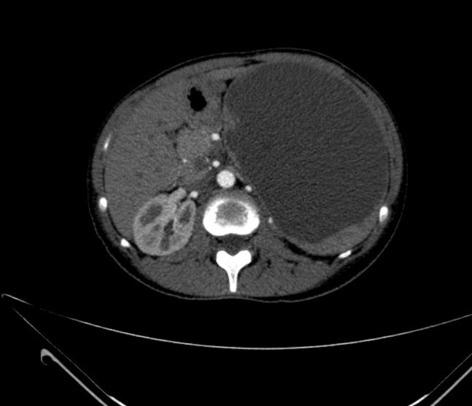

Karl Storz—EAES award session
Colorectal—benign
O190—Laparoscopic peritoneal lavage versus sigmoidectomy for perforated diverticulitis with purulent peritonitis: three-year follow-up of the randomised LOLA trial
Vincent Hoek1, P. P. Edomskis1, P. W. Stark1, D. P. V. Lambrichts1, E. C. J. Consten2, W. A. Draaisma3, J. F. Lange1, W. A. Bemelman4
1Erasmus University Medical Centre, Surgery, 2Meander Medical Centre, Surgery, 3Jeroen Bosch Hospital, Surgery, 4Amsterdam University Medical Centre, Surgery, The Netherlands
Background: This study aimed to compare laparoscopic lavage and sigmoidectomy as treatment for perforated diverticulitis with purulent peritonitis during a 36-month follow-up of the LOLA arm of the randomised LADIES trial.
Methods: Within the LOLA arm of the international, multicentre LADIES trial, patients with perforated diverticulitis with purulent peritonitis were randomised between laparoscopic lavage and sigmoidectomy (Hartmann’s procedure or primary anastomosis). Outcomes were retrospectively collected up to 36 months after randomisation in addition to the prospectively gathered 12-month follow-up. The primary outcome was the number of patients undergoing a reoperation (including stoma reversals). Secondary outcomes included stoma rates, percutaneous interventions, sigmoidectomy rates after initial treatment with lavage, sigmoid carcinomas, overall morbidity, and mortality.
Results: Long-term follow up was recorded in 77 of the 88 originally included patients, 38 were randomised to laparoscopic lavage (49%) and 39 to sigmoidectomy (51%). After 36 months, patients with one or more reoperations was significantly lower for lavage compared to sigmoidectomy (sigmoidectomy 27/39 (69%) versus lavage 17/38 (45%), RR 0.646, 95% CI 0.429–0.974, p = 0.039). Stoma percentages did not significantly differ (sigmoidectomy 11/39 (28%) versus lavage 4/38 (11%) versus, p = 0.083). Overall cumulative morbidity (sigmoidectomy 28/39 (72%) versus lavage 32/38 (84%), p = 0.272) and mortality (sigmoidectomy 7/39 (18%) versus lavage 6/38 (16%), p = 1.000) did not differ between groups. After 36 months, 21 of 38 (55%) patients treated with lavage did not undergo sigmoidectomy of which four patients passed away during follow-up. Four of 38 (11%) lavage patients and two of 39 (5%) sigmoidectomy patients were diagnosed with sigmoid carcinoma (p = 0.431).
Conclusion: Long-term results showed the number of patients who underwent one or more reoperations were significantly lower in the laparoscopic lavage group compared to the sigmoidectomy group as treatment for perforated diverticulitis with purulent peritonitis. No differences were found in terms of cumulative morbidity, stoma rates or mortality.
Upper GI—gastric cancer
O192—Comparative effectiveness of different pathologic techniques on lymph node count in gastric cancer specimens. A systematic review and network meta-analysis
Christos Athanasiou, L. Sreedharan, M. Lewis, S. Wemyss-Holden
Norfolk and Norwich University Hospitals, Upper GI, United Kingdom
Aims: Several studies have compared fat clearing and colouring techniques to the standard manual palpation aiming to increase the lymph nodes examined after gastrectomy for cancer but data on the optimal technique are still lacking. Our aim was to provide the first comparative effectiveness data on the matter.
Methods: PubMed, Embase, Scopus and Cochrane library were searched for studies comparing different pathologic techniques applied on gastrectomy specimens with aim to increase the lymph node yield. Effect modifiers such as the extent of lymphadenectomy, type of surgery, location of tumour, pathology and TNM stage were extracted to tables. Quality assessment of the studies performed with the Cochrane risk of bias tool. Pairwise and Network meta-analysis performed in Stata 14. Network plots were drawn for each outcome of interest. Surface under the cumulative ranking curve (SUCRA) was used to rank all available techniques.
Results: Eleven studies, three of which randomized were identified. Pathology methods included fat clearing solutions (Carnoy or acetone), methylene blue and the standard manual palpation. There were no studies comparing fat clearing (FC) to methylene blue (MB) as both techniques have been compared only to manual palpation. As compared to the standard technique both fat clearing and methylene blue had a statistically significant increase in the number of lymph nodes identified with Mean Difference (MD) = 8.6 (3.77,13.43) and 13.76 (8.44,19.07) respectively. FC vs MB for total lymph node yield did not reach statistical significance with MD = -5.16 (-12.33,2.02). MB had a probability of 91.9% of being the best technique for lymph node yield with FC coming second with probability of 8.1%. Upstaging was reported in five studies all of which compared FC to manual palpation. In the FC group upstaging had a higher chance of happening with a log OR = 2.25(0.85, 3.65).
Conclusions: MB is an easily implemented technique which confers significant benefits in total lymph node count as compared to manual palpation. Further studies are required to establish the effectiveness of FC as compared to MB.
Colorectal—Malignant
O193—The role of 3D modelling technology in recognition of colorectal tumour deposits
Anna Przedlacka1, S. Balyasnikova2, P. Tekkis1, G. Brown2, F. Bello3, C. Kontovounisios1
Imperial College London, 1Department of Surgery and Cancer, 2Radiology, 3Centre for Engagement and Simulation Science, United Kingdom
Aims: 3D modelling technology is rapidly gaining interest in various fields of surgery. It can be used for operative planning and navigation, as well as surgical education and patient interaction. It allows for depiction of complex anatomical relationships in a more comprehensible way than traditional radiological images. However, it also has potential to become a tool facilitating gaining further understanding of surgical pathology by allowing to display and analyse imaging data in a new way. Tumour deposits are a challenging entity. They are currently being closely investigated with an aim to develop understanding of their role in colorectal cancer spread. It is an ever evolving concept which requires further research to fully appreciate the origin and significance of tumour deposits. We applied the novel 3D modelling technology to illustrate tumour deposits in colorectal cancer.
Methods: 3D virtual models were created through manual segmentation of CT and MRI scans obtained according to protocols routinely used in colorectal cancer staging. No extra patient time or preparation were needed. CT and MRI images were analysed by Gastrointestinal Radiologist to delineate the tumour and provide the cancer staging. Manual segmentation was then performed in 3D Slicer, an open-source, free software used for creation of three-dimensional anatomical models. Additional post-processing was applied in MeshLab or Blender.
Results: Ten 3D models depicting tumour deposits in colorectal cancer were created. Models of right- and left-sided bowel cancer with tumour deposits were derived from CT scans, while those of rectal cancer—from MRI scans. 3D models depicted bowel with the tumour and tumour deposits, relevant vasculature and lymph nodes, as well as surrounding structures as required. Models can be manipulated to allow for most comprehensible inspection of different anatomical structures and relationships. The transparency of each structure can be changed. The morphological appearance of tumour deposits and their relation to vessels can be readily appreciated. The morphological differences between the tumour deposits and lymph nodes, both benign and metastatic, can also be evaluated.
Conclusions: This work follows on from our previous experience with exploration of 3D modelling technology to map tumour deposits in rectal cancer, based on rectal MRI images. This innovative technology shows a huge potential to enhance our understanding of surgical pathology. It can provide a welcome assistance in exploring new concepts and developing new theories. It can facilitate communication and discussion around the evolving concepts. It is a versatile novel tool which can be successfully applied for depiction of tumour deposits in any part of the bowel. Here we showed its feasibility for the use in left- and right-sided bowel cancer, in addition to previously explored rectal cancer. It can utilise modalities commonly used in colorectal cancer staging – CT and MRI, which renders it clinically applicable. While there is an ongoing debate on the correct classification of tumour deposits and their full significance in metastatic process, as well as their prognostic value, 3D technology can facilitate familarisation with their appearance. It can also become an educational tool both for radiologists and surgeons and a valuable adjunct in the multidisciplinary management of colorectal cancer.
Hepato-biliairy & pancreas—gallbladder
O194—Particularities of acute cholecystitis in the pandemic period—What happens to non-Covid19 patients?
Nicoleta Leopa, R.C Popescu
Emergency Country Hospital of Constanta, General Surgery, Romania
Gallstones are a common gastrointestinal disease that can have major complications and can affects up to 20% of patients in Europe, becoming a major public health problem. The most common complication of gallstones is acute cholecystitis (AC). Among patients presenting to the Emergency Service Unit (ESU) with acute abdominal symptoms, acute cholecystitis is found in approximately 3–9% of cases.
Aims: To identify the peculiarities of the management of AC with medium and severe forms, in the Covid19 pandemic period compared to the period before the pandemic.
Methods: A retrospective, comparative study was performed of moderate and severe cases of AC (according to the Tokyo 2018 guideline classification) presented in the ESU of Constanta County Hospital, Romania and hospitalized in the General Surgery Department between March-November 2020 and the similar period of 2019.
Result: The comparative analysis of the data shows a decrease in the number of presentations in ESU of AC cases during the pandemic, compared to the previous year, most often due to patients' fear of contacting the virus in the hospital environment. The median time between the onset of symptoms and the presentation in the ESU: 2020 – 14 days, 2019 – 5 days. Forms of moderate and severe AC predominated in the pandemic: GradeI—14.28%; GradeII—57.14%; GradeIII—28.57%. In 2019 GradeI—66.39%, GradeII—27.73%, GradeIII—5.88%. Laparoscopic cholecystectomy was attempted for all patients from the beginning, but the complications identified during surgery and severe forms led to a conversion rate in 2020 of 14.28%, compared to 5.88% in 2019. The severity of the cases is also observed in the postoperative complications encountered (perihepatic abscess Fig. 2. Figure 2, wound infection, bile leak; 2019—5.04%, 2020—23.21%), which required surgical reinterventions to solve them (2019: 2.52%, 2020: 10.71%). The number of deaths was significantly higher in 2020 (5.35%), compared to 2019 (0.84%).
Conclusion: Neglecting this pathology frequently encountered in ESU can lead to life-threatening complications and therefore we argue that a laparoscopically resolved cholecystectomy even in the "Covid19 era" remains the gold standard, guaranteeing the best results. Initially attempted conservative treatment may be a solution, but in the long term it can lead to severe complications and high costs.


Hepato-biliairy & pancreas—gallbladder
O195—Post-operative recovery following laparoscopic cholecystectomy: a need to redefine the consent for cholecystectomy
James Lucocq, G. Radhakishnan, J. Scollay, P. Patil
Ninewells Hospital, Hepatopancreaticobiliary, United Kingdom
Introduction: Laparoscopic cholecystectomy (LC) is the first-line treatment option for symptomatic gallstone disease and is one of the most frequently performed surgical procedures, with 409,612 being performed between 2009 and 2014 in the UK. Despite laparoscopic cholecystectomies being a common operation, the listed risks and incidences on consent forms vary greatly and generally lack adequate detail. Understanding the risks of LC is necessary before patients can make an informed decision regarding operative management. Our primary aim was to provide a comprehensive analysis of the post-operative course of these patients with detailed descriptions of post-operative complications, imaging, intervention, prolonged admissions and readmissions.
Method: Emergency and elective LCs performed for all biliary pathology across three surgical units between January 2015 and January 2020 were included in the study. We retrospectively collected data and followed each patient up for 100 days post-operatively using data-linkage methodology. Data collected included demographic data, operative data, post-operative recovery, imaging, additional interventions and re-admissions. Elective re-admissions under other medical specialties and emergency admissions unrelated to the cholecystectomy were excluded.
Results: A total of 2775 patients were identified (median age, 53 years (range 13–92); M:F, 1:2.7). There were no deaths in the cohort; however, 18.4% had a complicated postoperative period requiring either prolonged hospital stay, further imaging, additional interventions or re-admission. Two hundred and ninety-nine patients (10.8%) had a prolonged post-operative stay and 289 patients (10.4%) required post-operative imaging or intervention (e.g. CT, 4.6%; MRCP, 4.6%; USS, 2.9%; ERCP, 1.7%; Laparoscopy, 1.0%). The rate of post-operative complications was 7.9% (220 patients; e.g. collections, 2.5%; bile leaks, 2.0%; retained stones, 1.6%). Two hundred and five patients (7.4%) were re-admitted for assessment related to the LC (median admission length, 3 days; IQR, 4; median number of days following discharge, 9 days; IQR, 28) and 80.5% required imaging or intervention.
Conclusion: Rates of complications, adverse post-operative recovery and re-admission are important indicators of morbidity that should inform patient and practitioner decision-making. Although having the reputation of largely an uncomplicated procedure, our data supports and illustrates the substantive morbidity associated with the operation. Referring physicians and patients should be counselled about the high morbidity rates so that they are well informed of their possible postoperative outcomes. This involves patient education and improved consent which should help decrease litigation. Our data should also prompt surgeons to take a more judicious approach when offering the procedure, particularly when the indication is insubstantial.
Upper GI—Reflux-Achalasia
O196—EndoFLIP tailored per-oral endoscopic myotomy: experience in two UK centres
Kaveetha Kandiah, W. Knight, J. Couch, N. Tewari, K. Ragunath, J. Catton, A. Botha
Nottingham University Hospital NHS Trust, Upper Gastrointestinal Surgery, United Kingdom
Background: Per-oral endoscopic myotomy (POEM) is an effective treatment for achalasia. Efficacy is equivalent to Laparoscopic Heller’s myotomy with the advantage of minimal access and shorter length of stay. Post-operative reflux rates are higher in POEM. The Functional Luminal Imaging Probe (FLIP) allows intraoperative measurement of lower oesophageal distensibility during per-oral endoscopic myotomy. In theory, this enables the operator to tailor the myotomy to ensure adequate distensibility whilst minimising post-operative reflux risk.
Methods: Two prospectively collected POEM databases were analysed from 2 UK tertiary upper GI centres.
The operators in each centre used intraoperative FLIP measurements to ensure adequate myotomy. Outcome measures included Eckardt score (where ≤ 3 indicated clinical success) and proton pump inhibitor use (PPI), collected at the first post-operative appointment. Length of stay was recorded, as were complications.
Results: 142 patients underwent POEM between 2015 and 2019 with 90% (128/142) clinical success. This improved to 93% (68/73) in the latter half of each series. 79% of the poor responders had previous interventions compared to 55% of responders (p = 0.09). Average post myotomy distensibility was 5.2 mm2/mmHg in responders and 3.11 in non-responders (p = 0.11). DI of > 4.5mm2/mmHg was associated with 100% clinical success. Myotomy length of < 7 cm was associated with 93% clinical success and 40% post op PPI use compared to 60% PPI use with longer myotomies. There were 2 type IIIa, 2 type IIIb and one type IV Clavien-Dindo complications.
Conclusion: This study represents one of the largest UK series of FLIP tailored per-oral endoscopic myotomy. FLIP allows intraoperative monitoring of oesophageal distensibility allowing tailoring of myotomies. Tailored myotomies ≤ 6 cm were effective and were associated with less PPI use post operatively. Early referral of patients to high volume centres, where myotomies can be tailored using FLIP may lead to improved outcomes. More collaborative data from high volume centres is needed to decipher optimal myotomy profiles.
Gerhard Buess EAES technology award session
Robotics & new techniques—technology
O164—Telestration with Augmented Reality for efficient visual presentation of intraoperative target structures in Minimally Invasive Surgery
Felix Nickel1, Caelan Haney1, F. Lang1, A. Gerhäuser1, M.W. Schmidt1, A. Huber1, K.F. Kowalewski2, H.G Kenngott1, B. Müller-Stich1
1University Hospital Heidelberg, Department of General, Visceral and Transplantation Surgery, 2University Hospital Mannheim, Department of Urology and Urosurgery, Germany
Guidance and feedback by experienced surgeons are key aspects in surgical training, especially in the technically challenging field of Minimally Invasive Surgery (MIS). Currently, guidance of young surgeons exists only in a verbal form for MIS. Therefore, communication issues and mistaken instructions as well as physical implementation are common problems in training. Correct recognition and identification of anatomical structures on the laparoscopic screen are challenging for learning surgeons and verbal instructions can be equivocal and difficult in this setting.
This study tested the new training approach telestration in MIS by supporting the communication between trainer and trainee surgeon via Augmented Reality (AR) on the operative screen. For this purpose, verbal instructions during the training were combined with visual guidance with the iSurgeon system: the experienced instructor`s hand is displayed with AR in real time on the laparoscopic screen (Fig. 1). Thereby, the trainee surgeon is supported with a quick and safe visual identification of anatomical target structures even during complex intraoperative situations and the tutor can guide the trainee virtually through the operation.
This study was performed in the training center for MIS of the Department of General, Visceral and Transplantation Surgery at Heidelberg University Hospital, Germany. The study was conducted as a monocentric, randomized controlled study with cross-over design. Laparoscopically naïve medical students participated in laparoscopic basic training and subsequently in a specifically designed training course.
The primary endpoint was defined as the total time needed for the training course. The use of AR led to a significantly faster execution of training tasks. This applied not only to single tasks, but also for total training time (1658 ± 375 s vs. 1163 ± 275 s, p < 0.001). Secondary end point was defined as error rate in training tasks. Interestingly, the application of AR significantly reduced errors in most tasks. Moreover, a survey of subjectively experienced workload using NASA-TLX questionnaire revealed a significant reduction of stress during training with AR (33.6 ± 12.5 vs. 30.6 ± 12.9, p < 0.022).
Telestration with AR with the iSurgeon system can efficiently support training of laparoscopic procedures by considerably improving training success and reducing intraoperative stress for junior surgeons. The next step will be the clinical application of the AR device in a translational study.

Robotics & new techniques—education
O165—The effect of introducing an error coping role model on efficacy and quality of training in laparoscopic knot tying—a randomized-controlled trial
Annabelle Gerhäuser, F. Lang, C. Wild, M.W. Schmidt, B.P. Müller-Stich, F. Nickel
University Hospital of Heidelberg, Department of General, Visceral, and Transplantation Surgery, Germany
Objective: The aim of this study was to examine whether efficiency in learning laparoscopic knot tying can be increased by shifting focus towards solution orientation and development of coping strategies for possible errors, and how such an approach affects learning motivation.
Background: Previous studies have indicated that observational learning using a coping model instead of the previously established mastery model could achieve better learning results. However, the coping model according to Lazarus has not yet been specifically tested for its efficiency as a fundamental instruction model in minimally invasive surgical training.
Methods: 55 laparoscopically naive medical students learned a standardized knot tying technique by means of an instructional video. The control group was only offered a mastery video free from mistakes. The intervention group, instructed on active error analysis, additionally watched freely selectable coping videos showing typical beginner errors including solution strategies. The primary endpoint of the study was the number of attempts to reach a predefined proficiency level, defined by time, Knot Quality- and OSATS-Score. Secondary endpoints included validated scores on current motivation (FAM), satisfaction with the performance and self-efficacy expectations (ASKU).
Results: Face and content validity and reliability of the coping videos were established. Intervention group needed a lower number of attempts until proficiency was reached with 18.8 ± 5.5 vs. 21.3 ± 6.5 for control group without reaching statistical significance in preliminary analyses (p = 0.142). However, there was a significantly higher fraction of good knots in the intervention group from the first intervention with 0.7 ± 0.1 vs. 0.6 ± 0.2 (p = 0.026). Over the whole period, the motivational subscore “interest” of FAM was significantly higher for the intervention group (p = 0.032), as well as subjective learning benefit (p = 0.002) and error-awareness (p < 0.001).
Conclusion: Using a coping role model for proactive compensation of possible errors improves learning motivation and understanding of the technique with a significant difference in its qualitative implementation in the current setting. The ability to think in a solution-oriented, independent way is necessary in surgery in order to recognise, understand and adequately deal with technical difficulties and complications.
Robotics & new techniques—basic and technical research
O166—Shortening surgical training through robotics: A randomised controlled trial of laparoscopic versus robotic surgical learning curves
Tamara Gall1, W. Alrawashdeh2, N. Soomro2, S. White2, L. Jiao1
1Imperial College, Surgery and Cancer, 2Freeman Hospital, Newcastle, United Kingdom
Objective: To compare laparoscopic with robotic training in surgical trainees and the surgically naïve.
Background: Minimally invasive surgery (MIS) has become the gold standard technique for many operations. However laparoscopic training has a long learning curve. Robotic solutions may shorten the training pathway.
Methods: Surgical trainees (ST group) were randomised to receive 6 h robotic or laparoscopic simulation training. They then performed cholecystectomy; continuous suture closure of a gastrostomy and interrupted suture closure of small bowel in cadaveric specimens. Medical students (MS group) had two hours robotic or laparoscopic simulation training followed by interrupted suture closure of a gastrostomy. The Global rating scale score (GRS, maximum score = 30), number of suture errors and time to complete each procedure was recorded.
Results: The median GRS score for the ST group was better for each procedure after robotic training (total GRS score 27.00 ± 6, n = 10) compared to laparoscopic training (18.00 ± 5, n = 10, p < 0.001). There were less errors made for the robotic group compared to the laparoscopic group for both continuous suture (7.00 ± 5 and 22.25 ± 5 respectively, p < 0.001) and interrupted sutures (8.25 ± 4 and 29.50 ± 8 respectively, p < 0.001). For the MS group, the robotic group (n = 10) completed 8.67 interrupted sutures with 15.50 errors in 40 min, compared to only 3.50 sutures with 40.00 errors in the laparoscopic group (n = 10; p < 0.001). The time take to complete each interrupted suture was 4.46 min (ST robotic group) and 4.62 min (MS robotic group). Compared with 7.30 min (ST group) and 11.67 min (MS group) for the laparoscopic groups. Fatigue and physical comfort levels were better after robotic operating compared to laparoscopic operating (p < 0.001) for both groups.
Conclusions: The acquisition of surgical skills in surgical trainees and the surgically naive takes less time with a robotic compared to laparoscopic platform.
Robotics & new techniques—solid organs
O167—Technical improvements of the anastomotic technique in robotic minimally invasive esophagectomy can significantly reduce anastomotic leak rates
Dolores Mueller, Jennifer Eckhoff, B. Babic, F. Gebauer, R. Datta, H. Schlößer, L. Schiffmann, W. Schroeder, C. Bruns, H. Fuchs
University of Cologne, Department for General, Visceral, Cancer and Transplant Surgery, Germany
Introduction: Minimally invasive surgery and lately the usage of robotic technology has reduced the invasiveness of procedures, leading to improved patient outcomes after esophagectomy. The esophagogastric anastomosis represents a crucial step of the Ivor-Lewis procedure, as technical errors may lead to anastomotic leakage and severe postoperative morbidity. Anastomotic integrity is influenced by many different factors and there is great technical variety among surgeons. We have previously shown that a standardized 28-mm circular stapled anastomosis is very safe in Hybrid Minimally Invasive Esophagectomy. The aim of this study was to present and evaluate our standardized robotic circular stapled anastomotic technique in comparison to our large Hybrid patient collective.
Methods: Analysis of our prospectively collected, IRB approved database of hybrid, open, and robotic esophagectomies was performed. Starting 01/2019, we implemented an updated robotic standardized anastomotic technique using a circular stapler and ICG (indocyanine green) for our RAMIE cases at our academic center (Picture 1). Outcomes of patients undergoing this standardized robotic Ivor Lewis esophagectomy for esophageal cancer from 01/2019 – 11/2020 were compared to our overall cohort from 06/2016–06/2020 (Hybrid/Open group).Propensity score matching comparing robotic to hybrid procedures will be performed and data will be presented upon the meeting.
Results: A total of 615 patients were analyzed. A total of 96 patients underwent a robotic assisted Ivor Lewis esophagectomy. Of these, a total of 56 patients underwent a robotic thoracic reconstruction using the updated standardized circular stapled anastomosis. A total of 64 patients were operated using an open approach and 455 underwent a hybrid procedure with a circular stapled anastomosis (Hybrid/Open group). Demographic and oncological data is shown in Table 1. Mean age was 63 years (range 46–80) in the robotic group and 63 years (range 33–91) in the hybrid/open group. Further details about postoperative complications are depicted in Table 2. One patient developed an anastomotic leak in the robotic group, resulting in an anastomotic leak rate of 1.8%. In comparison 63 patients (12%) developed an anastomotic leak in the Hybrid/Open group (p = 0.0132). Median length of stay (LOS) was 13 days in the robotic group (range 7–52), compared to a median LOS of 15 days (range 9–99) in the open/hybrid group.
Conclusion: A standardized circular stapled anastomosis in RAMIE cases for esophageal cancer may result in very low anastomotic leak rates and thereby positively influence outcomes in selected esophageal cancer patients.

Robotics & new techniques—solid organs
O168—adoption of minimally invasive techniques in esophagectomy for cancer on textbook outcomes
Sivesh Kamarajah1, Sheraz Markar2, E. Griffiths1, A. Phillips3, J. Ruurda4, R. van Hillegersberg4, W. Hofstetter5
1Queen Elizabeth Hospital Birmingham, University Hospitals Birmingham NHS Trus, Department of Upper Gastrointestinal Surgery, 2Imperial College London, London, Department of Surgery & Cancer 3Royal Victoria Infirmary, Newcastle University Trust Hospitals, Northern Oesophagogastric Unit, United Kingdom.4University Medical Center Utrecht, University Utrecht, Department of Surgery, The Netherlands. 5The University of Texas MD Anderson Cancer Center, Thoracic and Cardiovascular Surgery, USA
Introduction: Robotic and minimally invasive esophagectomy are increasingly adopted internationally, yet the impact of this new technique on textbook outcomes remains unquantified. This population-based cohort study aimed to compare rates of textbook outcomes following minimally invasive techniques of esophagectomy for esophageal cancers.
Patients and Methods: Data from the National Cancer Database (NCDB) in the United States from 2010 to 2017, was used to identify patients with non-metastatic esophageal adenocarcinoma receiving either open (OE, n = 11,442), laparoscopic (LMIE, n = 4,827) or robotic (RAMIE, n = 1,657) esophagectomy. Textbook outcomes were defined as margin negative resections, lymph node harvest 15, length of stay 21 days, no 90-day mortality and no 30-day readmissions. Multivariable logistic regression and Cox analyses were used to account for treatment selection bias.
Results: Patients receiving RAMIE were more commonly treated within high volume, academic centers and with advanced clinical T and N stage disease. From 2010 to 2017, the rates of textbook outcomes increased for open (26% to 42%), laparoscopic (34% to 50%) and robotic (41% to 43%) esophagectomies. Patients receiving RAMIE had significantly higher rates of textbook outcome compared to OE and LAMIE (44% vs 32% vs 43%, p < 0.001), which remained on logistic regression analysis for both LAMIE (OR: 1.35, p < 0.001) and RAMIE (OR: 1.41, p < 0.001) compared to OE. On Cox analyses, textbook outcomes (HR: 0.64, p < 0.001) and patients receiving RAMIE (HR: 0.92, p = 0.049) were independent prognostic factors of long-term survival.
Conclusion: Despite capturing the learning curve amongst surgeons, RAMIE within this national study was associated with improved textbook outcomes and long-term survival. Therefore, wider adoption of RAMIE maybe warranted owing to improved patient benefit.
Robotics & new techniques—technology
O169—HeiChole benchmark for surgical workflow and skill analysis—results of an international machine learning challenge on laparoscopic cholecystectomy
Anna Kisilenko1, S. Bodenstedt2, D. Tran1, P. Heger1, F. Nickel1, H. G. Kenngott1, D. Lubotsky1, L. Maier-Hein3, S. Speidel2, M. von Frankenberg4, B. P. Müller1, M. Wagner1
1Heidelberg University Hospital, General, Visceral and Transplant Surgery, 2National Center for Tumor Diseases, Partner site Dresden, Translational Surgical Oncology, 3German Cancer Research Center Heidelberg, Division for Computer-Assisted Medical Interventions, 4Salem Hospital of the evangelische Stadtmission Heidelberg, Surgery, Germany
Aims: Surgical workflow and skill analysis are key technologies for the next generation of cognitive surgical robots that use machine learning methods to increase the safety of the operation through context-sensitive warnings and semi-autonomous assistance. In surgical workflow analysis over 90% precision in classification has been reported for specific tasks on a single-center video dataset. In this work we investigated, whether these results can be achieved in a multi-center setting with more difficult recognition tasks such as surgical activity and surgical skill.
Methods: The data set contains 33 anonymized laparoscopic cholecystectomy videos from three surgical centers. Surgical workflow in the videos was annotated by medical experts using the free Anvil software in terms of phases, activities and instrument presence. The surgical skill was scored with Global Operative Assessment of Laparoscopic Skills (GOALS). To increase the reliability of the annotation, the phases were annotated independently by three medical experts and the surgical skill by two medical experts. Deviations were discussed and resolved by consensus.
The resulting data set was used in the international Endoscopic Vision Challenge 2019 (https://endovissub-workflowandskill.grand-challenge.org/), in which more than 10 research groups from around the world tested their machine learning algorithms.
Results: The data set comprised 33 videos with a total length of 22.01 h, including 250 phase transitions. Ten international teams participated in the machine learning challenge. For phase segmentation a F1-score up to 65.4% was achieved (n = 8 teams), for instrument presence detection up to 63.8% (n = 8 teams), but only up to 23.3% for action recognition (n = 5 teams). The average absolute error for skill assessment was 0.78 (n = 1 team).
Conclusions: Surgical Workflow and skill analysis is a promising technology to support surgeons in the operating room, but it is not solved yet. The underlying machine learning algorithms require even larger data sets for training that accurately mirror the variance of surgical procedures in different centers. Thus, it is of utmost importance for us as surgeons to create open datasets in order to allow the development of artificial intelligence and cognitive robots in surgery.
Robotics & new techniques—technology
O170—Benchmarking computer-generated 3-dimensional imaging among laparoscopy novices
Pietro Mascagni1, C. Fiorillo1, R. Watanabe2, S. Kanaji2, S. Perretta2, G. Costamagna1, B. Dallemagne2, J. Marescaux2
1Fondazione Policlinico Universitario Agostino Gemelli IRCCS, Digestive Surgical Endoscopy, Italy. 2IRCAD, Research Institute Against Digestive Cancer, Research, France
Aims: 3-dimensional (3D) imaging enhances laparoscopic performance, especially among trainees. However, laparoscopes capable of 3D imaging are still not widely available and this imaging modality may cause significant visual discomfort and headache. Systems to convert 2-dimensional (2D) videos into 3D videos in real-time could facilitate the adoption 3D imaging in laparoscopy and decrease 3D-induced symptoms. The aim of the present study is to benchmark computer-generated synthetic 3D (synt3D) versus standard, stereo camera 3D (stereo3D) and 2D imaging among inexperienced operators in a controlled setting.
Methods: Laparoscopy novices were enrolled to perform the 3 tasks of the Laparoscopic Skills Training and Testing (LASTT), a validated box trainer, guided by either 2D, stereo3D or synt3D imaging. LASTT tests the following skills: camera navigation using a 30°-degree scope, hand–eye coordination and bi-manual coordination. A novel, CE marked, 2D-to-3D video converter (Monostereo®, MedicalTek, Taiwan) was connected to a standard 2D laparoscope to provide synt3D. Monostereo® provides on demand (i.e., switch from 2 to 3D in a mouse-click) and adjustable (i.e., 1 to 5 images disparity level) synt3D imaging keeping original scope functions (e.g., fluorescence imaging). Time to complete each task was recorded as well as 3D-induced symptoms (5-point Likert scale).
Results: Two participants in the stereo3D group aborted the experiment due to 3D-induced dizziness during the camera navigation task. The remaining 45 laparoscopy novices (15 per imaging modality) completed the study. Synth3D imaging significantly shortened time to complete the camera navigation task when compared with 2D (98.40 ± 19.76 vs 115.82 ± 6.22 s, respectively; p < 0.01) and stereo3D (111.89 ± 12.42 s; p = 0.02) imaging. However, stereo3D imaging significantly shortened the mean time to complete the hand–eye coordination task when compared to 2D (95.25 ± 28.13 vs 134.96 ± 35.40 s, respectively; p < 0.01) and synth3D (139.84 ± 34.84 s; p < 0.01). Finally, stereo3D imaging and synth3D imaging led to comparable mean times to complete the bi-manual coordination task (150.34 ± 32.22 vs 166.80 ± 18.91 s, respectively; p = 0.06). The occurrence and severity of 3D-induced symptoms can be seen in Fig. 1.
Conclusion: Computer generated synthetic 3D imaging seems superior to standard, stereo camera 3D imaging in camera navigation, both in terms of performance and reduction of 3D-induced symptoms. However, standard 3D imaging may be more suitable for task requiring very precise movements. Clinical studies are warranted.

Oral presentations
Amazing technologies
O250—A novel veress needle mechanism that reduces overshooting after puncturing the abdominal wall
Roelf Postema1, D. Cefai2, B. van Straten2, R. Miedema2, L. Lesmana Hardjo2, F. Nickel3, T. Horeman-Franse2
1Amsterdam UMC, Surgery, 2Delft University of Technology, Biomechanical engineering, The Netherlands. 3Heidelberg University Hospital, general, visceral and transplantation surgery, Germany
Introduction: Complications that occur in laparoscopic surgery are often associated with the initial entry into the peritoneal cavity. The literature reported incidences of Veress Needle (VN) injuries of e.g. 0.31% and 0.23%. In a 2010 national survey of laparoscopic entry techniques in the Canadian General Surgical practice, 57.3% of respondents had either experienced or witnessed a serious laparoscopic entry complication like bowel perforation and vascular injury. As those complications are potentially life threatening and should be avoided at all costs, improving safety of this initial action is paramount.
Methods: Based on a bare minimum design approach with focus on function expansion of existing components, a new Safety mechanism was developed for the VN that decreases the risks of VN overshooting. The mechanism works by preventing the puncturing acceleration of the tip of the VN by decoupling the surgeon’s hand from the VN immediately after entering the abdomen. (Image 1).
Results: Based on a set of requirements, a first prototype of the VN + with force decoupling safety mechanism is presented and evaluated on an ex vivo porcine abdominal wall tissue model in a custom setup. The experiments conducted by two novices and one experienced surgeon indicated a significant difference between the attempts with a standard, conventional working VN (6.5 [5.5–7]) and VN + with decoupling mechanism (1.5 [1.5–2.5]) of p < 0.001. (Image 2).
Conclusion: A new decoupling safety mechanism was integrated successfully in a standard VN resulting in a VN + . The results from the pilot study indicate that this new VN + reduces overshooting with a minimum of 50% in a standardised ex-vivo setting on fresh porcine abdominal wall specimens.


Amazing technologies
O251—A randomized controlled trial comparing the da vinci robotic simulator with a novel portable VR simulator for robotic surgery (PoLaRS)
Tim Horeman1,3, Sem Hardon1, A. Kooijmans2, R. Horeman3, M. van der Elst3, A. Bloemendaal2
1Amsterdam UMC, Surgery, 2Reinier de Graaf Hospital, Surgery, 3Delft University of Technology, Biomechanical Engineering, The Netherlands
Background: Global use of surgical robotic systems is steadily increasing. Surgical simulation can be an excellent way for robotic surgeons to acquire and retain their skills. Currently commercially available surgical robot simulators are often compatible with just one robotic system. Besides these simulators are associated with a high cost. To address the need for training aimed to develop and validate a novel robotic surgery simulator (PoLaRS) (Fig. 1).
Methods: In this randomized controlled trial, trainees were enrolled and assigned into two groups after randomization (Fig. 2): the test group (n = 18) performing tasks in a fixed order on PoLaRS followed by the daVinci Simulator (dVSS), and the control group (n = 20) only performing tasks on the dVSS. Performance parameters were Time (s), Pathlength (mm/cm), and Number of collisions. Parameter data was compared in each group between the first and last trial of the test and post-test phase to identify learning effects, and between the two groups in the post-test phase to identify effects of prior PoLaRS training on performance. Questionnaire data was used as indication whether face and construct validity.
Results: Trainees who first performed tasks on the PoLaRS prototype did not significantly differ in performance on the dVSS compared to the control group. Learning curves showed similar shapes in both systems, and between both groups. Face- and construct validity was established. Participants recognised the potential benefit of simulation training on the PoLaRS system.
Conclusions: A novel VR portable robotic simulator was developed and validity was assessed. The PoLaRS system holds potential as a low-cost, portable VR system and it can be considered an alternative to current surgical robot simulators. As many novel surgical robotic systems will go to market in the coming years, PoLaRS can become a solution for the increasing demand for training of robotic surgery.


Amazing technologies
O252—Implementation of stereotactic navigation in colic surgery: initial experience of the Pelvinav trial
Antonio D'Urso, C. Gonzalez, A. Lapergola, G. Mathis, F. Alexandre, B. Dallemagne, D. Mutter
Hôpitaux Universitaires de Strasbourg, IRCAD, IHU,, Digestive surgery unit, France
Aims: Stereotactic navigation is a computer-assisted surgical system that enables surgeons to track surgical instruments in conjunction with CT/MRI during surgery. It is well established in neurosurgery and orthopedic surgery. Stereotactic navigation in the gasytrointestinal tract remains challenging because of tissue deformation and or organ motion. The aim is to evaluate the first results of the feasibility and precision of stereotaxic navigation in laparoscopic surgery for colic cancer. METHODS: Patients with colorectal cancer undergoing minimally-invasive approach were enrolled. Patients were divided in two groups: patients with preoperative CT-Scan performed with fiducials at our institution not needing intraoperative images acquisition(Arm1) and patients with CT-scan previously performed needing intraoperative acquisition (robotic c-Arm) of images to establish intraoperative navigation(Arm2). The "accuracy" of surgical navigation is defined as the distance measured between the position of "surgical" previously defined anatomical landmarks, pointed with a surgical instrument tracked by the navigation system, and corresponding location of the instrument in the navigation image. A distance equal to or less than 4 mm between the two locations is considered as an optimum accuracy.
Results: Navigation was performed in 6 patients (3males/3females), mean age 70 yo (54–85). Procedures performed: 4 right, 1 total, 1 sigmoid colectomy. Four patients in ARM1; 2 patients in Arm2. C-Arm acquisition time in Arm2 were 23 and 10 min. Mean registration time was 2.8 min (1–5). Mean navigation time was 22.5 min(18–26). Measures of navigation before dissection showed a mean difference of 57.1 mm(15–159.2); after dissection mean distance was 12.7 mm (3.8–19.5). Navigation improved identification of landmarks. Main difficulties encountered during navigation were: CT-Scan and C-Arm images fusion; change of landmarks not visible on CT-scan, difficult instrument tracker fixation to laparoscopic grasper because not conceived for that, patient tracker not visible, structures identified for navigation sometimes altered after dissection or hidden before mobilisation, difficulty to align in a perpendicular line the instrument plate with the camera site, one navigation not done because instrument tracker not recognized.
Conclusion: Navigation in colic surgery remains challenging requiring improvements of accuracy. Identification and resolution of technical problems will increase the precision of stereotactic navigation and help surgeon to correctly identify surgical landmarks.
Amazing technologies
O253—Development and pilot-testing of an intra-operative Smartphone App for use during laparoscopic cholecystectomy procedures
Michael Dennis dela Paz1, M.M. Calimag2, M. Mendoza3
1Asian Hospital and Medical Center/ University of Santo Tomas Graduate School, Department of Surgery, 2University of Santo Tomas, UST Graduate School, 3Asian Hospital and Medical Center, Department of Surgery, Philippines
Laparoscopic cholecystectomy, the gold standard treatment for symptomatic gallstones, has a treacherous risk of bile duct injury (BDI). Since 1995, a universal culture of safety for cholecystectomy was established when Strasberg introduced the "Critical View of Safety" (CVS) which leads to various training and innovative programs whose main goal is to absolutely eliminate BDI. Until now, a gap still exists as estimated 3 out of 1000 cholecystectomies still lead to BDI globally and there is no concrete database of this complication in the Philippines yet. Development of a Smartphone Application that identifies CVS intra-operatively through image recognition of posted doublet view pictures of perceived CVS and then involves a community of expert surgeons for real-time networking decision strategy can be an armament to attain zero BDI. Aside for being a concrete registry of laparoscopic cholecystectomy, this App serves as an intra-operative time-out checklist in laparoscopic cholecystectomy after dissecting the gallbladder and before ligating any structure. It also serve as a help-center to notify expert surgeon nearby to assist whenever there is a difficult laparoscopic cholecystectomy case where CVS can't be attained. Efficacy of Smartphone Artificial Intelligence over the standard Tele-mentoring factor of the expert surgeons was put to test as a preliminary internal validation of the use of this technology by logging moot and academic CVS and non-CVS pictures in the App. Both the results of the image recognition as well as the answer of the expert surgeons are at par with accuracy and precision of identifying the critical view of safety. Recommendation that in the future, this surgical safety App can be used in actual laparoscopic cholecystectomy procedure as an interactive zero bile duct injury timeout procedure right before clipping or ligating any structures as a pro-active way of preventing BDI complication.


Amazing technologies
O255—New method in safe tissue handling; an innovatively balanced compliant laparoscopic grasper
Jan-Willem Klok1, A.T Steinþórsson4, R. Postema3, J.L Herder2, J. Dankelman1, T. Horeman1
1Delft University of Technology, BioMechanical Engineering, 2Precision and Microsystems Engineering, 3Spijkenisse Medical Center, The Netherlands. 4Reon, Iceland
Introduction: In laparoscopic surgery, haptic feedback is limited compared to open surgery as tissue can only be indirectly “felt” through the instrument tip shaft and handle. Therefore, surgeons find it difficult to perceive forces exerted to the tissue, as well as to asses tissue characteristics through haptic feedback. This is due to poor transmission of surgeons’ instrument control forces, caused by friction and play in the grasper joints. These factors negatively impact instrument haptic feedback and can cause excessive tissue damage. Therefore, a laparoscopic grasper overcoming these problems has been designed (Fig. 1).
Methods: This laparoscopic grasper features a novel compliant grasper tip type. In contrast to conventional laparoscopic graspers, this compliant grasper tip does not have joints that can cause play or friction. Instead, it utilizes elastic elements facilitating the opening and closing movement of the jaws. However, this tip introduces undesired internal elastic forces, which distort the perception of tissue forces through the instrument. To improve the compliant grasper’s haptic feedback, these internal forces should not be perceived by the surgeon. Therefore, a balancing mechanism was added to compensate these undesired forces by exerting a balancing force in the instrument. The instrument sensitivity was validated by measuring the level at which participants could discriminate force differences applied at the grasper tip with an increasing force level, while the subjects were holding the new instrument and a conventional grasper at the handle grip. The force was increased and subjects reported at which force level they were able to feel an increase. Also, mechanical efficiency of both graspers was measured.
Result: There was a significant difference in sensitivity between the instruments (p < < 0.05) in favour for the compliant grasper (mean 1.4 N SD0.44 N) compared to the conventional grasper (mean 2.7 N SD1.2 N) (Fig. 2). The mechanical efficiency of the new instrument and conventional grasper is 43% and 25%, respectively.
Discussion & Conclusion: The results show that the compliant laparoscopic grasper has a higher force sensitivity and a higher mechanical efficiency than a conventional grasper, enabling to perceive lower tip forces. This has significant benefits, potentially lowering the threshold of tissue forces that a surgeon can perceive, improving the perception of grasper tip-tissue interaction. The instrument can help surgeons to discern healthy and cancerous tissue by perceiving stiffness. Surgeons might even become aware of dynamic processes such as blood pulses through a compliant grasper. Currently, a next prototype of the novel instrument is being designed, with an improved circular grasper tip, better suited for grasping tissue and with less balancing demand, reducing internal forces. Validation will be aimed towards preventing excessive tissue damage by improving instrument tip control and handle design.


Amazing technologies
O256—ActivSightTM dye-less visualization of tissue perfusion in MIS surgery: interim analysis of first clinical (n = 66) and preclinical (n = 20) studies with ICG comparison
Christina Sanders1, Chibueze Nwaiwu1, Y Liu1, A.N Panchal2, J.L Butsch2, A.B Hoffman2, A.R Posner2, M.A Falvo2, J Visco2, J.B Ortolani2, S.M Barone2, M.D Burstein2, C DeJesus2, N Bouvy3, L Boni4, S.K Shah5, E.B Wilson5, A.F Dechert6, V.E Buharin6, S.D Schwaitzberg2, P.C.W Kim1,
1Warren Alpert Medical School of Brown University, Rhode Island Hospital, Providence, Rhode Island; Activ Surgical, Inc., Boston, Department of Surgery, USA. 2Jacobs School of Medicine and Biomedical Sciences, The State University of New York, Buffalo General Hospital, Buffalo, New York, Department of Surgery, USA. 3Maastricht University Medical Center, Maastricht, Department of Surgery, The Netherlands. 4Fondazione IRCCS—Ca' Granda, Ospedale Maggiore Policlinico, University of Milan, Milan, Department of Surgery, Italy. 5McGovern Medical School, University of Texas Health Science Center at Houston, Houston, Texas, Division of Minimally Invasive and Elective General Surgery, Department of Surgery, USA.6Activ Surgical, Inc., Boston, Massachussetts, USA
Introduction: Real-time physiologic imaging is an inevitable necessity to improve clinical outcomes. Today, indocyanine green (ICG) is commonly used for intraoperative assessment of tissue perfusion, however, its use is complicated by: (1) pharmacokinetics and user interpretation variance; (2) workflow inconvenience; and (3) capital costs. Laser speckle contrast imaging (LSCI) uses coherent laser light to show perfusion in open surgery, but no form-factor exists for MIS use (laparoscopic or robot-assisted). We report an interim analysis of the first multi-center usability and utility clinical trial using a dye-less technology, and real-time relative quantification of tissue perfusion from preclinical studies.
Methods: ActivSightTM, an FDA-cleared device, consists of an imaging module (an adapter positioned between any white light camera and laparoscope) and a light engine. LSCI detects tissue perfusion without an external fluorophore and displays it to the surgeon as a color heatmap. ActivSightTM also visualizes ICG using near infrared fluorescence (NIRF). Usability was determined using human factor testing on a Likert scale (1–5) while utility was measured by comparing perfusion detection between ICG and LSCI modes (without fluorophore). Accuracy of ICG and LSCI perfusion display was determined in user post-hoc survey comparing white light, ICG, and LSCI intraoperative images from sleeve gastrectomies. Relative quantification was measured in co-axial spotlighted areas, translating a perfusion heatmap to numerical values using proprietary algorithms.
Results: 66 consecutive patients undergoing elective MIS colorectal, bariatric surgeries, and cholecystectomies (LC) (Table 1) between 11/2020 and 07/2021 were enrolled (NCT#04,633,512). Usability evaluation (n = 22 surgeons) demonstrated: display quality of 4.07 + 0.86; ease of setup 4.26 + 0.85; and form-factor 3.82 + 1.57; and weight 3.73 + 1.10. No adverse events occurred in patients, surgeons, or systems (Table 1). Perfusion boundaries (Fig. 1A–D) on post-hoc surveys (n = 10) were concordant between intraoperatively identified boundaries (ground truth) and LSCI images (p = 0.329), and significantly discordant with ICG images detected within two minutes of first ICG injection (p = 0.043). After multiple ICG injections, residual ICG was detected in non-perfused tissue (Fig. 1E). This false-positive display was absent when using LSCI (Fig. 1F). In porcine models, relative perfusion units obtained using LSCI (Fig. 1I–L) were significantly higher in vascular vs non-vascular tissue (294.41 vs 35.08, p < 0.0001).
Table 1.
Patient Demographics and Outcomes
| Patient demographics/outcomes | Colorectal n (%) | Bariatric n (%) | Laparoscopic/Robotic Cholecystectomy n (%) |
|---|---|---|---|
| Number |
RCo: 8 (47.1) LCo/LAR: 9 (52.9) |
GBP: 13 (56.52) SG: 10 (43.48) |
26 (100) |
|
Age (yrs; mean ± SD) |
66.59 ± 10.87 | 44.34 ± 11.18 | 54.33 ± 11.87 |
| Sex (male:female) | 1:1.43 | 1:3.60 | 1:2.70 |
| BMI (mean ± SD) | 29.77 ± 6.15 | 43.98 ± 7.53 | 31.49 ± 6.36 |
| Indication for surgery |
Neoplasms: 14 (82.35) Crohn’s disease: 1 (5.88) Diverticulitis: 2 (11.76) |
Morbid obesity: 21 (91.30) GERDa: 2 (8.70) |
Sx chole: 14 (53.84) AC: 7 (26.92) Bil Dys: 4 (15.38) CC: 2 (7.69) Choledocholithiasis: 1 (3.85) |
| 28-day post-operative complication rateb | 0 (0) | 0 (0) | 0 (0) |
RCo Right Colectomy, LCo Left Colectomy, LAR Low Anterior Resection, GBP Gastric Bypass, SG Sleeve Gastrectomy
aGERD Gastroesophageal Reflux Disease only, Sx Chole Symptomatic Cholelithiasis, AC Acute Cholecystitis, Bil Dys Biliary Dyskinesia, CC Chronic cholecystitis, BMI Body Mass Index, SD Standard deviation
bData available for 40 patients.
Conclusion: Combining LSCI and NIRF in a laparoscopy-compatible form-factor, ActivSightTM, provides accurate, repeatable, on-demand, real-time visualization of tissue perfusion without a fluorophore. Perfusion detection and display using LSCI showed more spatiotemporal accuracy than ICG. The preclinical quantification feature of ActivSightTM detects and displays consistent specific perfusion measurements.

Amazing technologies
O257—ArtiSential—a revolution in advanced laparoscopic instrumentation
Ibrahim Darwich1, M. Chand2, H. Schipper3, F. Willeke1.
1Leitender Oberarzt Chir. Klinik, Surgery, Germany. 2University College London, Surgery, UK. 3Livesmed Institute, Surgery, Germany
There is now consensus that where possible, minimally invasive surgery should be offered to patients for improved clinical outcomes. However, universal adoption and penetration of laparoscopy into healthcare systems has been challenging over the past two decades. Whilst there are certain procedures which are ubiquitously carried out with laparoscopy, for example, cholecystectomy, there is much variability in other seemingly more complex procedures. One of the main drivers of this has been the relative rudimentary, straight laparoscopic instruments which limit accessibility and manoeuvrability in confined spaces such as the pelvis and thorax. Consequently. in some countries where resources exist there has been a push towards robotics where advanced instrumentation allows an increased range of movements and thereby making difficult anatomy more accessible.
Until now there have been early attempts at producing advanced laparoscopic systems but these have been cumbersome and limited in their engineering. We present a revolutionary new advanced laparoscopic instrumentation system called ArtiSential. The ArtiSential instruments include bipolar forceps, Maryland dissector, monopolar spatula, monopolar hook, needle holder, with more on the way. They allow a wide range of articulating movement through 7 degrees of freedom that can mimic the dexterity of robotic platforms (Fig. 1). Traditional laparoscopic instruments have limited range of movements but these instruments allow for complex articulating movements in different planes which can be further exploited around the fulcrum of the port. This additional articulation means that there is better access to difficult part of anatomy. Furthermore, there is tactile feedback on the instrument handset which is lightweight and disposable.
Our initial series of cases include pelvic colorectal surgery and demonstrate the advantages of articulating instruments (Fig. 2). Further, we demonstrate that there is a learning curve to these instruments to maximise their benefit during complex procedures. We suggest adopting the formal training programme which includes a period of dry lab training before embarking on clinical cases so that surgeons may truly benefit from these advanced instruments. This also allows for safer introduction of new technology.
Advanced laparoscopic instruments such as ArtiSential should be used to make challenging aspects of laparoscopic surgery more accessible. These are not substitute for all straight instruments but best used to maintain precision during difficult manoeuvres in combination with traditional instruments.
Finally, with improving image displays including 4 K and 3D, a combination of articulating advanced instrumentation and superior image quality will be a credible and financially viable alternative for those surgeons unable to access robotic platforms in the future.


Amazing technologies
O258—Liver 3D printed mold for training in liver ultrasound guided procedures – concept and development
Radu Claudiu Elisei1, 2, F. Graur1, C. Popa1, S.V. Moldovan, E. Mois1, D.Pisla3, C. Vaida3, H. Stefanescu4, A. Cote5, N. Al Hajjar1
1University of Medicine and Pharmacy “Iuliu Hatieganu” Cluj-Napoca, 2Emergency County Hospital, Bistrita, Romania, General Surgery, 3Technical University Cluj-Napoca, Romania, Robotics Department, 4Gastroenterology and Hepatology Regional Institut “ Octavian Fodor”, Cluj-Napoca, 5Emergency County Hospital, Oradea, Romania, General Surgery, Romania
Introduction and background: In the twenty-first century, the rapidly evolving technological environment and the steep progress of medical science made the intraoperative ultrasound examination a mainstay for the correct and complete surgical treatment.
Hence, there is no interventional and diagnostic liver ultrasound specific training program in the surgical residency curriculum. Thus, the development of an experimental training model ment for interventional liver ultrasound became a necessity.
By using the already widespread 3D printing technology, we created a reproducible, low cost, multiple usage experimental liver model adapted to this purpose.
Materials and methods: By using a liver’s CT scan 3D virtual reconstruction, we have created a 3D live size virtual liver mold subsequently transformed into a real mold by 3D printing it with the FDM (fused deposition modelling) technology.
In this mold we have cast various liver models using several solution recipes with gelatin and liquid silicone for the liver parenchyma whereas for the liver tumors we added special dyes. With the gelatin based tumors we used wheat flour, talcum powder and corn starch for ultrasonographic contrast. All the models were analyzed for manufacturing time, cost, fiability, ultrasonic morphological testing and elastography.
Results: We conceived and made one model of 13 Shore hardness scale silicon model and three different concentrations gelatin models.
The silicon model is more expensive to manufacture, it is easier to handle but it has a hardness and a resilience to punctures too important for the purpose. It can probably be softened with the addition of siliconic oils, with the disadvantage of increasing the cost.
The gelatin models are more brittle and less long lasting but do have a stiffness closer to the cirrhotic liver (about 40 kPa for the intermediate model). The costs of the silicon model compared to gelatin model are 1:10. The higher concentration gelatin model behaves perfectly for handling as well as ultrasound-guided punctions.
Conclusion: The gelatin models with intermediate and higher stiffness proved to be the most fiabile for training in interventional liver ultrasound.
Key words: training, liver, experimental model, 3D printing, ultrasound-guided procedures, intraoperative ultrasound.


Amazing technologies
O259—Feasibility of bowel perfusion assessment using the laparoscopic laser speckle contrast imaging device Lapvas-Imaging
Wido Heeman
UMCG, Surgery, The Netherlands
The primary therapeutic modality for colorectal cancer is surgery. Although oncologically effective, a persisting dreadful complication of surgery is anastomotic leakage. Despite the multi-factorial origin, the general consensus is that an important factor is the state of microcirculation at the site of the anastomosis, which cannot be assessed with the naked eye. Lapvas-Imaging is a contactless, dye-free imaging modality that gives instantaneous and continuous real-time insight in the state of bowel perfusion during laparoscopic surgery. The medical device is based on a technique called laser speckle contrast imaging and works plug-and-play with standard commercial laparoscopes. This study aims to determine whether the use of additional Lapvas-imaging derived visual feedback might influence the surgeon’s choice for the location of the anastomosis.
In this prospective, observational, multi-center trial, patients undergoing an oncological colorectal resection were included. 2D-perfusion maps were generated from images taken with Lapvas-Imaging (LIMIS Development BV, Leeuwarden, The Netherlands) in combination with a standard surgical laparoscope and video system (EndoEye, Olympus Medical, Hamburg, Germany) during surgery, before the creation of the proximal and distal anastomosis. The images were shown to the operating surgeon and non-involved surgeons postoperatively.
In this ongoing trial, 16 patients with oncological colorectal resections were included. No medical device related adverse events were observed. Images reveal anastomosis made in well-perfused tissue (Fig. 1A) as well as on the border of poor-perfused tissue (Fig. 1B). Lapvas-Imaging could instantaneously visualize the perfusion and discriminate well- and poor perfused bowel with only 3 min 6 s average added surgical time (Fig. 2A). Preliminary results show that operating surgeons would have changed the anastomosis in 39% (Fig. 2B) of the patients, with an average of 1.2 cm. One patient developed anastomotic leakage that was indicated for a change in location based on Lapvas-Imaging.
Preliminary results show that the bowel perfusion can be real-time visualized using standard laparoscopic video systems in conjunction with Lapvas-Imaging. Furthermore, the 39% indication of change in clinical decision-making could indicate that surgeon’s value the added perfusion information. Patient inclusion will be continued and updated results will be presented to evaluate its potential for bowel perfusion imaging.


Amazing technologies
O260—Implementing artificial intelligence tools for quality improvement of robotic assisted minimally invasive esophagectomy (RAMIE)
Dolores Mueller1, Jennifer Eckhoff1, B. Babic1, L. Schiffmann1, O. Meireles2, P. de Backer3, N. de Taye3, C. Bruns1, H. Fuchs1
1University of Cologne, Department for General, Visceral, Cancer and Transplant Surgery, Germany. 2Massachusetts General Hospital, Surgical AI & Innovation Laboratory, Department of Surgery, USA. 3ORSI Innotech, Belgium
Background: Advances in artificial intelligence (AI), machine learning, and sensors are now the driving force in innovation in robotic assisted gastrointestinal surgery. We have previously published a modular step-up approach for safe introduction of robotic assisted minimally invasive esophagectomy (RAMIE), defining 6 different phases of the surgery. As anastomotic leak depicts one of the most severe and early postoperative complications and is considered a benchmark for the quality of the esophagectomy we are aiming to apply artificial intelligence and machine learning tools to successfully implement an automated surgical phase recognition for RAMIE in addition to using the same AI techniques to detect surgical quality metrics, focusing on the anastomotic phase as a crucial surgical phase.
Methods: Starting 01/2019, we implemented a standardized robotic anastomotic technique using a circular stapler and ICG (indocyanine green) for our RAMIE cases at our academic center (Fig. 1). Video material of standardized RAMIE cases was recorded and criteria for selection of suitable videos for annotation were defined. Those included high video quality and performance of a standardized anastomotic phase. Anastomotic phase was defined to begin when the cautery hook touches the esophagus, and the esophagus is divided. Next a monofilament purse string suture is performed robotically. One 12-mm assistant trocar is then removed, and this incision is extended to a mini thoracotomy with a standardized length of 7 cm. The stapler head is inserted and sutured into the esophageal stump using the prepared purse string suture using the robotic instruments. Its end was defined as when the circular stapler head is successfully sutured in and the needle is cut off. Next, video annotation was performed using pixel annotation for tool identification and vector annotation for identification of instrument direction and head of the used instrument (Figs. 2 and 3).
Results: Since 01/2019 a total of 94 RAMIE cases were performed, all cases were set up to be recorded. Successful and complete video recording was found in 60% of cases. N = 15 videos were evaluated for video annotation. 60% (n = 9 videos) were found suitable for annotation as defined above. Reasons for exclusion were failure of standardization of the anastomotic phase such as change of circular stapler size, additional lymphadenectomy, additional swap in the picture, rupture of suture, incomplete video or minor bleeding. Mean time of the anastomotic phase was 27.39 min (range 22.03 min- 30.97 min). The robotically performed part of the anastomotic phase showed a mean of 18.19 min, compared to a mean of. 9.2 min of mini-thoracotomy and stapler head introduction. This leads to a total of 163.72 min of video data suitable for annotation. Interestingly, annotation was found to be more time consuming than previously published as 4 instruments were actively used compared to 2 for e.g. in robotic urological surgery. An average of 6 min per picture were found for pixel annotation, compared to 3 min for vector annotation.
Conclusion: Video standardization is more important than ever when implementing artificial intelligence tools. Standardization may include factors such as quality, resolution, frame rate, however, also includes technical aspects of the operative technique. Interestingly, even though a standardized approach was applied, only 60% of all recorded videos were found to have a truly standardized anastomotic phase.

Figure 2 Pixel annotation

Figure 3 Vector annotation

Amazing technologies
O261—Intraoperative Navigation for Robot-assisted Radiofrequent Ablation
Dmitry Panchenkov1, D. Klimov2, Y. Poduraev2, A. Baranov1, A Nechunaev1, A Levin2, A. Vorotnikov2, Y. Stepanova1, L. Prokhorenko2, E. Grigorieva3, D. Astakhov1, R. Liskevich1
A.I. Evdokimov Moscow State University of Medicine and Dentistry, 1Surgery and Surgical Technologies, 2Medical Robotechnics, 3CT, Russia
Background and purpose: Modern research shows that robotic systems for minimally invasive surgical operations significantly increase their quality and efficiency. In particular, this is due to the fact that modern robotic systems are able to achieve higher accuracy parameters than are allowed by natural human systems. Methods of minimally invasive diagnostics and local destruction of the affected tissues, such as radiofrequency ablation (RFA), require high precision at the operation stage. The movement and deformation of the organs in the abdominal zone, caused by breathing and other processes, leads to a deviation of the target neoplasm's position from the preliminary plan of the operation, built based on CT. In this regard, in the case of using robotic systems in minimally invasive surgery, there is a need for intraoperative navigation that provides operational data on the target's position for automated control of a medical instrument.
Method: The project aims to develop an intraoperative navigation system for a robotic surgical system for minimally invasive surgery based on a combination of ultrasound, stereophotogrammetric navigation, and modern computer vision algorithms. It will allow for automatic tracking of the position of target areas of the patient's operating area in real-time, thus increasing the accuracy of novel robotic systems for minimally invasive surgery.
Results and conclusion: Created RFA robotic surgical system integrates an automated ultrasonic needle localization system based on a vision system with stereotactic navigation.This approach involves the combined use of preoperative medical images based on CT / MRI and intraoperative ultrasound images to clarify the displacement of the target anatomical structures caused by breathing and other processes in the patient's body.
Amazing technologies
O262—Implementation of wearable tech in the OR, challenges met and resolved during the TedTrial
Tim Feenstra1, M. Jansen1, H. Meije1r, T. Grantcharov2, M. Schijven1
1Amsterdam UMC, Surgery, The Netherlands. 2St. Michaels Hospital, Surgery, Canada
Background: The TedTrial aims to evaluate if and how the interaction with electronically controlled operating room (OR) systems used during minimally invasive surgery (MIS) can be improved. Currently, this interaction is performed by a third person (a circulating OR nurse), which is compared to direct hands-free interaction using voice-control and gesture-control. As with many trials regarding technology, the execution and implementation of the technology have been challenging. Therefore, here we want to share our preliminary results and address these challenges, how to prevent them if possible, and how to solve them when encountered.
Methods: The TedCube© system is a plug-and-play device enabling direct hands-free and sterile control of the OR environment by the surgeon. The trial is conducted in a stepped wedge design with three different arms: 1) business as usual arm or third-person interaction with OR environment by the OR-nurse 2) voice-controlled interaction with OR environment by the surgeon, 3) gesture-controlled interaction with OR environment by the surgeon. Endpoints are objective outcomes such as workflow disruptions, error rate, delay, and measured stress, as well as subjective outcomes such as frustration and satisfaction with the system and the workflow of its use. By retrospectively reviewing the project implementation and start-up, several areas were identified as challenging during this research project.
(Preliminary) results: Despite encountered challenges, using this novel hands-free technology to control the OR environment seems feasible. During the amazing technologies sessions, we will share our first results and reflect on the encountered challenges and lessons learned during this project.
Amazing technologies
O263—The study on artificial intelligence (AI) colonoscopy in affecting the rate of polyp detection in colonoscopy – a single center retrospective study
Yuen Ting Wong, K.F Wong
New Territories West Cluster, Hospital Authority, Surgery, China
Background: The application of high technology in endoscopy affects the outcomes significantly. Artificial Intelligence (AI) in Colonoscopy (CLN) may help increase the polyp detection rate (PDR). The aim of this study was to evaluate if the application of AI CLN (ENDO-AID) could increase the PDR.
Methods: A single center retrospective study was performed in Tin Shui Wai Hospital. PDR in CLN from 11/2020 to 2/2021 after the application of ENDO-AID/Artificial Intelligence (AI group) was compared to the cases from 4–11/2020 before the application of the practice (non-AI group). Procedures were performed by one endoscopist with experience in performing CLN > 3,000. Variables, such as patients’ demographic data, indications for CLN, incidence of PDR, Boston Bowel Preparation Scale BBPS, withdrawal time, post CLN complication rate between the 2 groups, were compared. Categorical and continuous variables were analyzed by using the χ2 test (Fisher exact test if needed) and Mann–Whitney test respectively. Results were considered to be significant if p-value < 0.05.
Results: Total 184 patients with CLN done were recruited. 93 patients (50.5%) were in the non-AI group while 91 patients (49.5%) were in the AI group. The mean age of the non-AI was higher than the AI group (65.6 vs 60.0, P = 0.04*), otherwise, there was no significant difference in sex (P = 0.44), indications (e.g. follow up CLN for polyp/ cancer, per-rectal bleeding, altered bowel habit, history of colectomy done, etc.)(P > 0.05), BBPS (8.18 vs 8.05, P = 0.289), withdrawal time (7.03 min vs 7.48 min, P = 0.243), completion rate (97.8% vs 97.8%, P = 1.0) and complication rate (0% in both groups, P = 1.0) between groups. (Table 1 and 2).
Table 1.
Demographics and weight loss in diabetic and non-diabetic cohorts
| Diabetic Cohort | Non-diabetic Cohort | |
|---|---|---|
| Age | 46 (± 10) | 43 (± 9) |
| Gender: Females % | 70% | 82% |
| Pre-operative BMI | 47 (± 8) | 47 (± 7) |
| Pre-operative Weight (kg) | 129 (± 22) | 129 (± 21) |
| Excess Body Weight (EBW)a | 60 (± 19) | 61 (± 19) |
| Duration of diabetes pre-op (years) (n = 66) | 5.6 (± 4.4) | NA |
| % Excess weight loss (EWL) at short-term | 59% (± 23) | 63% (± 23) |
| % Total Weight loss (TWL) at short-term | 27% (± 10) | 29 (± 10) |
| % Excess weight loss (EWL) at long-term | 60% (± 29) | 58% (± 31) |
| % Total weight loss (TWL) at long-term | 28% (± 13) | 27% (± 14) |
Table 2.
A table showing the hypoglycaemic agents taken by patients in our study group
| Pre-RYGB | Post RYGB Short term FU |
Post RYGB Long term FU | |
|---|---|---|---|
| Insulin ± Oral | 26 (26.3%’) | 8 | 26 |
| Oral only | 73 (73.3%) | 23 | 37 |
| Off all diabetic | 0 | 68 | 36 |
| Total | 99 | 99 | 99 |
In the contrary, PDR was significantly higher in the AI group than the non-AI group (67.0% vs 48.4%, P-value < 0.01*). (Fig. 1) Besides, adenoma detection rate was also significantly higher in the AI group than the non-AI group (50.5% vs 35.5%, P-value 0.039*). (Fig. 2).
Conclusions: AI CLN is useful to detect polyp and can be an extra-pair of eyes during procedures to improve the PDR.
Amazing technologies
O264—A new scope warmer/cleaner in the era of global surgery
Yuto Kubo1, T. Yasui2, H.K Bhattacharjee4, Y. Matsuda2, K .Yamashita3, T Saito3, T. Tanaka3, T. Makino3, T. Takahashi3, Y Kurokawa3, H. Eguchi3, Y. Doki3, K. Nakajima1
1Osaka University, Graduate School of Medicine, Department of Next Generation Endoscopic Intervention (Project ENGINE), 2Daiei company limited, 3Osaka University, Graduate School of Medicine, Department of Gastroenterological Surgery, Japan. 4All India Institute of Medical Sciences, Department of Surgical Disciplines, India
Background: The fogging and stain on the laparoscope lens have negative impact on surgical visualization. Our pilot study showed that the fogging occurred when the temperature of laparoscopic tip was 3.5 °C lower than that of abdominal cavity. We hence focused on a “disposable hot pack,” a technology that originated in Japan. The hot pack may have a potential to become a sustainable, inexpensive and effective device in the era of global surgery.
Purpose: To develop a hot pack with anti-fogging and cleaning function.
Methods: Bench test: (Nonwoven fabric) 50 μl pseudo-blood was applied to the tip of a 10 mm diameter glass rod, and it was wiped using a conventional nonwoven fabric without and with surfactant for 5 s, respectively, and its tip was evaluated visually. Next, its tip after wiping was immersed in 1 ml saline for 5 s, and the absorbance of the solution (520 nm) was measured. (Heating method) The surface and inside temperature of prototype device was continuously evaluated for 60 min using temperature/humidity sensors (MSHTDL-16, SysCom).
Pre-clinical trial: In swine under general anaesthesia, the temperature and humidity at the laparoscopic tip and in the abdominal cavity, as well as body surface and room temperature were continuously measured. (Anti-fogging) The laparoscope was inserted into the abdominal cavity for 5 min and evaluated whether the fogging occurs on the lens after heating laparoscopic tip with 65 °C saline or prototype device for 10 s. (Wiping) The laparoscopic tip heated with prototype for 10 s was inserted into the abdominal cavity. Stains were created by soaking laparoscopic tip in 50 ml saline stored in the left subdiaphragmatic space. Then, the laparoscope was removed and wiped with prototype device for 10 s, re-inserted to the abdominal cavity and evaluated the stains on laparoscopic tip. The all above evaluation was repeated five times.
Results: Bench test: (Nonwoven fabric) The visually pseudo-blood on the tip of the glass rod after wiping was lower with surfactant than without surfactant. Furthermore, the absorbance was significantly lower with surfactant than without surfactant (p = 0.025). (Heating method) The maximum temperature was significantly higher inside the folded device than on its surface (52.5 °C vs 43.5 °C, p = 0.012). The temperature reached to its peak after 40 min.
Pre-clinical trial: Based on these results, pre-clinical trial was evaluated using the final prototype made of nonwoven fabric with surfactant. The device was opened 40 min before starting the trial. (Anti-fogging) The temperature and the humidity in the abdominal cavity were around 33 °C and 84%, respectively. The laparoscopic tip heated by 65 °C saline or the prototype did not occur fogging in all trials. Also, temperature of the laparoscopic tip at 5 min after inserting into the abdominal cavity was similar between two heating methods (65 °C saline vs prototype, 33.4 °C vs 32.8 °C). (Cleaning) The temperature of its tip before and after cleaning was 31.7 °C and 33.9 °C, respectively, and there was no stains in all trials.
Conclusion: The disposable hot pack has a strong potential to be used as an anti-fogging and cleaning device. The device can be used instead of warmed saline worldwide.
Amazing technologies
O265—Laparoscopic funduplication with HandXTM hook and needle holder
Amir Szold, Monica Ortenzi
Assuta medical center, Assia Medical group, Israel
Background: HandX™ is a handheld, powered laparoscopic device with interchanging single-patient fully articulating instruments, that was recently introduced to the market. The HandXTM consists in a modular platform that could be used by the operating surgeon beside the patient’s bed. It is electromechanically controlled, and, as the manual interface is handled by the surgeon, the movements of the surgeon’s wrist and fingers are translated to the instrument-articulating tip. In times of an increasing awareness for healthcare system costs, it offers the possibility to improve surgeon’s dexterity, precision and ergonomics in a more cost-effective manner than other platforms. Previously it has been used either for tissue manipulation or suturing.
This report is to show the feasibility and safety of this technology implemented with a monopolar dissecting hook in a complex abdominal procedure.
Methods: We report the case of the laparoscopic repair of a giant hiatal hernia using HandXTM instruments.
Results: The index case was a 69-year-old female with symptomatic large paraesophageal hiatal hernia. The patient complained of progressive chest pain and dysphagia. A CT scan demonstrated a diaphragmatic hernia with most of the stomach inside the thorax.
Surgery: Three 5 mm trocars 1 in the left midclavicular line, 1 in on the right of the midline close to the costal arch and 1 asistant on the right midclavicular line and another 11 mm umbilical trocar were used. The sac was dissected with the HandXTM monopolar hook and the stomach was fully reduced into the abdomen. The hiatus was closed with three separated stiches handled with the articulating needle holder. The utilisation of another energy source was used only for the division of the short gastric vessels. A Nissen funduplication was performed. Three separated stiches were used to secure the wrap with the help of HandX needle holder. At the end of the operation a mesh was used to reinforce the hiatus. The operative time was 80 min, no blood loss nor intraoperative or post-operative complications were recorded.
Conclusions: This report showed the feasibility and safety of the new HandX TM platform to perform a complex laparoscopic procedure. Further development of the energy source are needed to allow to carry out the procedure safely without any change of instrument during the operation, however, the hook HandXTM technology could be safely adopted to obtain fine dissection.
Amazing technologies
O266—Predictive nomogram Anastomotic leak and implementation of intraoperative procedures to prevent it (PRAI study): a novel technique to evaluate anastomotic vascularization
Monica Ortenzi1, A. Carsetti2, M. Palmieri1, E. Casarotta2, A Donati2, M. Guerrieri1
Università Politecnica delle Marche, 1Clinica Chirurgica, 2Clinica di Ansestesia e Rianimazione, Italy
Introduction: Although altered microcirculation is defined as an independent risk factor for anastomotic leak few studies evaluated its impact on anastomotic leak and using different devices, although, none has become widely accepted for several reasons: high variability of the measurements, long duration of measurements, difficult access in the pelvis, the need to leave catheters in situ or costs. This report shows our initial experience measuring gut microcirculatory density and flow with the aid of incidence dark-field (IDF) videomicroscopy (Cytocam, Braedius, Amsterdam, The Netherlands).
Materials and methods: Videos from 5 different sites (at least 10 s/site) were recorded from both the mucosal and serosal site of the left colon end once the colonic resection was performed. At both time points with adequate focus and contrast and every effort was made to avoid movement and pressure artefacts. Poor-quality images were discarded and 3 images for each time point were selected and analyzed using a computer software package (Automated Vascular Analysis Sofware, Microvision Medical BV, Amsterdam, The Netherlands). According to the consensus report on the performance and evaluation of microcirculation using IDF imaging, total vessel density (TVD) and perfused vessel density (PVD) were calculated for small vessels (diameter < 20 μm). The De Backer score was calculated as described previously. The proportion of perfused vessels (PPV) and the microvascular flow index (MFI), reflecting microcirculatory blood flow velocity, were analyzed semi-quantitatively in small vessels, as de- scribed elsewhere. The flow heterogeneity index (HI) was also calculated as the highest MFI minus the lowest MFI divided by the mean MFI, providing an index of heterogeneous microcirculatory perfusion. At each recording noninvasive measurement of blood pressure, heart rate, temperature, use of vasoactive drugs and peripheral oxygen saturation (measured with a probe on a digit or ear) were simultaneously recorded.
Results: Six patients were considered eligible for the study (males = 4, 66.6%; mean age = 61.2), all of them underwent laparoscopic anterior resection. All the procedure were performed by a single experienced surgeon. The mean BMI was 25.45 kg/m2 (95%CI = 21.49–29.27). TVD, PPV were analysed in 3 patients and TVD and PPV were 3 and 100 for all of them respectively while the mean MFI was 12.1 (95%CI = 0.01–24.40). The mean PVD was 4,6125 (95%CI = 3.27–5.94) while the mean De Becker score was 10,3183 (95%CI = 6,1272 to 14,5095). In 1 patient (16.6%) the finding of an vascularization resulted in the change of the operative strategy with an extension of the resection point. In this patient the PVD was 2.78, and De Becker score was 7.69. No intraoperative complications were recorded. One patient experienced major bleeding in the post-operative period that was managed with a second laparoscopy. No anastomotic leak was observed. The mean length of hospital stay was 7,7500 (95%CI = 0.01–24.40).
Conclusions: Though the results are preliminary this type of anastomotic evaluation showed to be feasible, safe and useful to easily detect any alteration of the resected colon before anastomotic construction. Moreover, in times when the constant increasing awareness for costs of the healthcare system could pose a limit to the spread of new technologies this type of anastomotic evaluation offers a in a more cost-effective manner than other devices.
Amazing technologies
O267—Advanced pre-operative studies visualization and navigation using volume rendering of point-cloud in mixed reality devices for minimally invasive surgeries
Carlos Plaza de Miguel1, Juan A. Sánchez-Margallo2, R.A Fernández Anzules3, F.M Sánchez-Margallo1
#Jesús Usón Minimally Invasive Surgery Centre, 1TREMIRS Unit, Jesús Usón Minimally Invasive Surgery Centre, 2Bioengineering and Health Technologies Unit, 3Cáceres University Hospital, Thoracic Surgery Unit, Spain
Introduction: The use of mixed reality (MR) techniques during surgical planning and assistance is a recent and continuously developing field. However, MR devices, such as Microsoft HoloLens, present performance issues when viewing raw point clouds of 3D volumetric models of preoperative imaging studies. Solutions on the market (e.g., Azure Remote Rendering Cloud) usually present a high cost and require high speed Internet connections. In this study we present a new approach for rendering and stereoscopic visualization of 3D volumes of preoperative imaging studies using MR technology.
Materials and methods: A specific application has been developed for the HoloLens v2 that optimizes the visualization of preoperative imaging studies by using a system of interactive cameras. These interactive cameras render the visualized point cloud in a stereoscopic way. The method makes use of two cameras with 3D perspective, one of them interactive and the other fixed (attached to the user's vision) that renders what the interactive camera sees. The user can move the interactive camera to visualize the patient's anatomy by means of intuitive hand gestures. Additionally, use has been made of the so-called one-dimensional transfer function, which makes it possible to visualize the point cloud with different presets according to the density level of each voxel, allowing different anatomical systems to be visualized with a series of preset colors.
Results: The visualization of a preoperative imaging studies with MR glasses using traditional techniques achieves, at most, 5 frames per seconds (FPS) of real-time rendering of the point cloud. This fact may cause dizziness in the user, making it impossible to interact smoothly with the preoperative study. The developed method allows to visualize the volumetric cloud of the preoperative study at a frame rate higher than 30 FPS. It also allows the user to enter the volumetric cloud and visualize internal anatomical structures. Examples of the transfer functions (left) and the results obtained in the image (right) are shown in Fig. 1. Figure 1A shows a preset for a greater arc of tissue density, while Fig. 1B is slightly more restricted and Fig. 1C shows a preset providing greater detail of less dense anatomical structures. The latter was used for surgical planning of a right upper lobectomy. This preset facilitated the visualization of the branches of the lung to be resected, as well as the branches of the pulmonary arterial and venous systems, which made it possible to study the area affected by the tumor in greater detail. Using hand gestures, the surgeon was able to place the volumetric point cloud in a position similar to that of the patient, facilitating real-time localization of the affected area and more accurate surgical planning. The surgery was performed without complications.
Conclusions: In this study we present the first real-time application that allows stereoscopic 3D visualization and navigation of preoperative imaging studies without the need for Internet streaming or other paid service. Being able to visualize preoperative studies as a point cloud and stereoscopically provides the surgical team with greater detail of the patient's anatomy compared to traditional 2D visualization. This procedure provides a more realistic image and depth perception, substantially increasing the spatial perception of the patient's anatomy.
Amazing technologies
O271—Robotic versus laparoscopic adrenalectomy: systemic review
Emad Rezkallah1, W.M Elsaify1, A. Elsaify2, G. Lim1
1South Tees NHS foundation Trust, General Surgery, United Kingdom. 2Misr University for Science and Technology, Medical School, Egypt
Background: Minimal invasive surgery has become the standard for most surgical procedures now. Many studies have tried to compare robotic versus laparoscopic to adrenalectomy. Objectives: The aim of this study is to review most of the available studies comparing robotic to laparoscopic adrenalectomy to evaluate which procedure provides the superior clinical outcomes.
Methods: A systematic literature search of ScienceDirect and PubMed databases. The perioperative clinical outcomes were collected by two independent reviewers. We used Random-effects (DerSimonian-Laird) models to get the pooled effect estimates.
Results: 18 studies were eligible in our study. 10 of them were prospective and 8 were retrospective. A total of 1376 patients underwent adrenalectomy, 592 (43.02%) were treated with RA and 784 (56.9%) with the LA technique. There were no significant differences between both groups regarding the conversion rate (Odds ratio: 0.70, 95% CI 0.31–1.57, P = 0.65), intraoperative complications (OR: 2.18, 95% CI 0.49- 9.71, P = 0.28), post-operative complications (OR: 0.83, 95% CI: 0.55–1.24, P = 0.49), and mortality (OR: 0.42, 95% CI: 0.07–2.72, P = 0.98). However, robotic adrenalectomy was associated with longer operative times (MD: 9.89 min, 95% CI: -2.79 to 22.58), shorter hospital stay (MD: -0.33, 95% CI: -0.46 to -0.21) with less blood loss (MD: -25.34, 95% CI: -36.77 to -13.91).
Conclusions: We proved that robotic adrenalectomy has equal safety and feasibility with similar clinical outcomes when compared with laparoscopic approach. However, better well-designed studies are required to determine the role and cost-effectiveness of robotic adrenal surgery.
Bariatrics—laparoscopic
O134—Endoscopic internal drainage with prompt external drainage mobilization prevent chronic gastric fistula in complicated cases of bariatric surgery
Panagiotis Lainas1, 2, C. Dammaro1, J.L. Dumont2, H. Tranchart1, G. Donatelli2, I. Dagher1
1Antoine-Beclere Hospital, Department of Minimally Invasive Digestive Surgery, 2Peupliers Private Hospital, Department of Endoscopy, France. 3 Antoine-Beclere Hospital, Department of Minimally Invasive Digestive Surgery, France. 4 Peupliers Private Hospital, Department of Endoscopy, France. 5 Antoine-Beclere Hospital, Department of Minimally Invasive Digestive Surgery, France
Aims: Despite advances in treating gastric staple line leaks after bariatric surgical procedures, chronic leaks have been reported. Failure of their treatment frequently leads to radical surgery. The aim of this study was to describe a strategy for preventing occurrence of chronic gastric leaks after complicated bariatric surgery in patients necessitating relaparoscopy and external drainage as a first step of gastric leak management.
Methods: Data from 14 consecutive patients admitted for gastric leak after laparoscopic sleeve gastrectomy were prospectively collected and retrospectively analyzed. Patients included underwent relaparoscopy and external drainage as first step of management.
Results: Median time to gastric leak detection was 4 days. Emergency relaparoscopy allowed peritoneal lavage and external drainage placement next to the leak. Median time between surgery and endoscopic internal drainage (EID) was 4 days. Progressive external drainage mobilization started 2 days after EID. Control endoscopy was performed every four weeks until healing. A median interval of 112 days was necessary before healing and EID retrieval. Thirteen patients (92.8%) had no gastric leak recurrence at one year. In one patient, EID was considerably delayed and external drainage mobilization prolonged, leading to chronic gastric leak and total gastrectomy after 18 months.
Conclusion: This study reports for the first time a well-standardized protocol of early EID after relaparoscopy coupled to rapid external drainage removal to promote healing and prevent chronic fistulas in complicated cases of bariatric surgery. Bariatric surgeons should be aware of such therapeutic strategies and include them in their arsenal against postoperative gastric staple line leaks in severely obese patients.
Bariatrics—laparoscopic
O034—Three-port laparoscopic sleeve gastrectomy for morbid obesity
Vasileios Drakopoulos, K. Rekouna, P. Trakosari, M.C. Papadopoulou, K. Pavlopoulos, V. Vougas
Evangelismos General Hospital, 1st Dep. of Surgery and Transplant Unit, Greece
Background: Sleeve gastrectomy is traditionally performed with the aid of 5 to 7 abdominal trocars. We aim to present our experience concerning laparoscopic sleeve gastrectomy for morbid obesity, with a more minimal invasive approach, using three ports- trocars.
Introduction: Laparoscopic Sleeve Gastrectomy (LSG) is traditionally performed using 5 to 7 abdominal trocars. By reducing the number of trocars, parietal trauma, pain and hernia risks can be minimized.
Objectives: We present our 7-year experience from May 2014 to April 2021 concerning LSG for morbid obesity using three trocars, with emphasis on a simple suture-based trocar-free liver retractor.
Methods: Three trocars are typically used: one 10-mm periumbilical optical trocar and two 12-mm trocars on the midclavicular lines. A suture is percutaneously inserted and fixed to the right crus of the diaphragm. Careful traction lifts the left hepatic lobe offering better surgical field and access to the gastroesophageal junction. A gauze is used to protect liver parenchyma from possible injury. Furthermore, sectioning and stapling of the stomach is performed before the gastroepiploic division, reducing the need of another left sided trocar.
Results: All the patients had an uncomplicated recovery. No liver injury or wound problem was mentioned.
Conclusions: The placement of a suture at the right crus of the diaphragm can reduce the number of trocars, leading to less postoperative pain, risk of hernia and better cosmetic outcome without compromising the safety of the operation or the rate of postoperative complications.
Bariatrics—laparoscopic
O035—Bariatric surgery patient’s profile in Latvia
Guna Bilande1, M. Mukans2, I. Troickis3, O. Kozlovskis4, E. Liepins5, J. Zarinovs6, V. Pirags7
1Aiwa clinic, Jurmala hospital, University of Latvia, Faculty of Medicine, Surgery, 2Aiwa clinic, Riga Stradins University Faculty of Medicine, Surgery, 3Aiwa clinic, Jurmala Hospital, Surgery, 4Sigulda hospital, Surgery, 5Jurmala hospital, Surgery, 6Sigulda hospital, Riga 1st hospital, Surgery, 7Pauls Stradins Clinical University Hospital, University of Latvia, Faculty of Medicine, Department of Endocrinology, Latvia
Background: As we know obesity is a chronic metabolic disease characterised by an increase of body fat stores. It is a gateway to ill health, and it has become one of the leading causes of disability and death, affecting not only adults but also children and adolescents worldwide. For long term obesity has been overviewed only as a problem of fat and gluttonous people and their abnormal eating habits, but there are more issues than just overeating and low physical activity. According to latest statistical data reported by Central Statistical Bureau of Latvia (CSB) there is more than 24.1% of people obese in Latvia and it’s one of the highest rates in Europe.
Aims: The aim of the study is to bring an update on bariatric surgery patient profile in Latvia.
Methods: This was quantitative cohort prospective study that was carried out in three clinics in Latvia. All patient participation was random and voluntary, and patient history data was used in this study.
Results: During 1 year 62 patient data were collected (42 woman, 20 man) with average age 44.6 years. More than 50% of all patients BMI was higher than 40 kg/m2 (in average 45.1 kg/m2). Almost 1/5 (19.4%) of all patients were superobese with BMI more than 50 kg/m2. 2/3 of all surgeries done were gastric bypass and only 1/3 sleeve gastrectomy. Medium BMI prior gastric bypass surgery was 46 kg/m2, but sleeve gastrectomy – 40 kg/m2. Most common comorbidities for patients were: 90% gastrointestinal problems, 58% GERD, 52% cardiovascular problems, 48% had musculoskeletal problems, 45% liver disease, 42% lung problems and 23% endocrine disorders. Average weight loss during first 3 months post-surgery was 40% of excess weight.
Conclusions. Bariatric surgery was mostly done for woman in middle age with multiple comorbidities. Gastric bypass surgery was performed the most and mostly for patients with higher BMI comparing to those who underwent sleeve gastrectomy.
Bariatrics—laparoscopic
O036—What really matters when you perform a Roux-en-Y Gastric ByPass ?
Jean-Philippe Magema
CHU UCL Namur, Dinant, Visceral Surgery Unit, Belgium.
Lack of standardization in the Roux -en -Y Gastric Bypass (RYGBP) is quite well established. We all learned the basics the technique but a lot of differences do exist in performing each step of the procedure. Based on scientific evidences, coming from an extensive and meticulous review of the literature of the last twenty years, we thus review the different technical steps and their importance to try and propose a standardization” of RYGBP.
Ante-colic of retro-colic, gastric pouch size, stoma size, banded / gastric remnant resection.
limbs size, A limb length / B limb length, handsewn or stapled linear / circular anastomosis.
type of Stiches, mesenterical / Petersen defect closure, leak tests: M-Blue / Air / ICG, ports closure are the points enfocussed.
A lot of possibilities exist at each and every step of a RYGBP.
They influence the post operative complications, the end weight loss (EWL), the weight regain, the resolution of obesity bounded co-mobidities.
Furthermore, lack of standardization leads to problems regarding the interpretation and comparison of scientific data in the reated literature.
Bariatrics—laparoscopic
O040—Sleeve after band: an outdated concept? 8 years follow-up of a multicenter study
Francesco De Angelis1, C. Boru1, A. Iossa1, C. Campanile2, P. Perrotta3, G. Silecchia1
1Sapienza Universita' Di Roma—ICOT Hospital, Department of General surgery and Bariatric centre of Excellence, 2Ospedale Civita Castellana, Department of General Surgery, 3Presidio ospedaliero di Villa D'Agri, Department of General Surgery, Italy
Laparoscopic adjustable gastric band (LAGB) is the bariatric procedure most likely subject to revisional surgery (RBS). Both Roux-en-Y gastric bypass (LRYGB) and Sleeve Gastrectomy (LSG) represent viable options as RBS after failed LAGB, especially in the short-term follow-up. Nevertheless, the long-term results for both revisional procedures are still lacking.
Aim: to evaluate the long-term results (8 years) of a cohort of patients submitted to revisional LSG in "2 step" approach after failed LAGB.
Material and Methods: multicenter cohort study involving 76 patients operated between 2008–2011. The revisional group (RG) included revisional LSGs after failed LAGB, while the control group (PG), included cross-matched LSGs performed in the same period as a primary procedure. The primary endpoint was to evaluate the weight loss in terms of % EWL, % of total weight loss (%TWL) and % of excess BMI loss (%EBL) after revisional LSG. The secondary endpoint was to evaluate the need of further bariatric procedures after failed RBS.
Results: after 8 years follow up, 44 patients (10 M/34F) were available; the PG included 62 patients (11 M/51F). The 8-year % EWL was 54% in the RG and 66% in the PG, (p = 0.01). The %EBMIL was significantly higher in the PG (79%vs64% p < 0.05) as well as the %TWL (34% vs 26% p < 0.002). Ten patients from the RG (22,7%) underwent further laparoscopic RYGB as RBS after the third year of follow-up due to severe GERD associated with a grade B esophagitis or higher in 87.5% of the cases. A concomitant type I hiatal hernia (HH) was detected in 50% of these patients. Eight patients (13%) from the PG were converted after 3 years of follow-up for IWL/WR (62%) and for severe GERD associated with esophagitis grade B or higher in 38%. No patient that underwent additional RBS, from both groups, had post-operative complications or mortality.
Conclusions: The need of redo surgery in the revisional LSG group was higher than in PG, both for postoperative GERD and IWL. In the bariatric centers involved in this study LSG is no longer proposed as revisional surgery after failed gastric band, preferring RYGB or one anastomosis gastric bypass (OAGB).
Bariatrics—laparoscopic
O085—Prevalence of sarcopenia in patients with morbid obesity complicated by type 2 diabetes mellitus
Alexander Khitaryan1, A. Abovyan2, V. Mezhunts1, V.Sarkisyan2, A. Melnikov1
1NHI “Railway Clinical Hospital at the “Rostov-Glavnyi” station, Russian Railways, OJSC” Rostov-on-Don, Russian Federation, Surgical, 2Rostov State Medical University, Surgical, Russia
Relevance: Bariatric surgery continues to be the most reliable and effective way to reduce weight in patients with morbid obesity today. One of the effects of bariatric surgery is remission of type 2 diabetes mellitus (T2DM). However, the problem of sarcopenia in bariatric patients with type 2 diabetes mellitus is not well understood. Bioelectrical impedance analysis (BIA)is a modern method that allows to identify the phenomena of sarcopenia in patients with normal indicators of protein metabolism (total protein, albumin).
Key words: obesity, bariatric surgery, type 2 diabetes mellitus, sarcopenia, bioelectrical impedance analysis.
Aim: The aim of our study was to investigate the prevalence of sarcopenia in bariatric patients with T2DM.
Materials and methods: This prospective study included the results of a preoperative examination of 116 obese patients. Among the patients there were 28 men and 88 women aged 56 to 68 years with a BMI of 35 to 62 kg/m2. All subjects were divided into 2 groups depending on the presence or absence of T2DM signs. The first group included 60 patients with T2DM. The second group consisted of 56 patients without T2DM signs. Statistical analysis of the results was carried out using Statistica 12.0. All patients underwent a standard set of studies with the obligatory determination of the level of total protein and albumin. The skeletal muscle mass index (SMMI) was additionally investigated using BIA in order to identify signs of protein deficiency and sarcopenia. Moderate sarcopenia was diagnosed at SMMI equal 8,51–10,75 kg/m2 for men and 5,76–6,75 kg/m2 for women, severe sarcopenia—SMMI ≤ 8,5 kg/m2 for men and ≤ 5.75 kg/m2 for women.
Results: In the first group, the average BMI was 46.7 ± 1.8 kg/m2, the average glucose level was 7.9 ± 0.4 mmol/L, and HbA1C was 7.6 ± 0.2%. Signs of moderate sarcopenia were found in 22 (36.7%) patients. In the control group, the average BMI was 44.5 ± 1.2 kg/m2, the average glucose level was 5.8 ± 0.3 mmol/L, and HbA1C was 5.4 ± 0.2%. Signs of moderate sarcopenia were detected in 4 (7.1%) patients. The average levels of total protein and albumin in both groups were within the reference values (total protein > 64 g/L, albumin > 30 g/L).
Findings: Sarcopenia is more common in bariatric patients with T2DM than in patients without T2DM (36.7% versus 7.1% according to our study).
According to BIA, signs of moderate sarcopenia were detected in patients with normal values of total protein and albumin. This, in our opinion, allows us to consider BIA as a more sensitive method for diagnosing sarcopenia in bariatric patients at the stage of preoperative examination in order to predict long-term postoperative complications and choose surgical tactics.
Bariatrics—laparoscopic
O086—OS-MRS score does not predict 30-day complications in those undergoing bariatric surgery
Thomas Chase1, H. Malik2, K. Theodoropoulou1, W. Lynn3, K. Devalia2, A. Goralczyk2, J. Loy2, R. Aguilo2, S. Agrawal2, Y. Koak2
Homerton University Hospital, 1General Surgery, 2Bariatric Surgery, 3Maidstone and Tunbridge Wells NHS Trust, Surgery, United Kingdom
Aims: Patients undergoing bariatric surgery are often co-mordid, and already classed as American Society of Anesthesiologists (ASA) ≥ 2 due to their high BMI. Scoring systems such as the Obesity Surgery Mortality Risk Score (OS-MRS) have been developed to attempt to predict outcomes after Bariatric surgery based on early outcome data. We evaluated whether the OS-MRS score predicted complications in patients undergoing bariatric surgery in a single UK centre.
Methods: Consecutive patients who had undergone bariatric surgery at a single major centre in the UK between Jul 2014 and Dec 2018 were included in a retrospective longitudinal cohort study. Patients were subdivided into those undergoing gastric bypass (BP) and sleeve gastrectomy (SG). Univariate and multivariate regression analysis (controlling for initial BMI, smoking, hypertension, cardiovascular disease and obstructive sleep apnoea) was conducted looking at OS-MRS score vs. 30-day complications.
Results: 1076 patients (244 males, mean age 46) were included of which 473 underwent BP (120 single anastomosis gastric bypass and 353 roux en Y gastric bypass) and 603 had SG. The pre-operative BMI of those undergoing BP and SG was 47.4 and was 49.8 respectively. 40 (8%) of patients undergoing BP and 49 (8%) of those undergoing SG had a 30-day complication. The average OS-MRS for those without complication was 2.0 and 2.2 for those with complication in BP and 2.0 vs 1.8 for SG. Univariate analysis odds ratio (OR) for OS-MRS vs. 30-day complication was 1.12 (p = 0.39) for BP and 0.88 (p = 0.27) for SG. Multivariate analysis OR was 0.64 (p = 0.20) and 0.85 (p = 0.65) for BP and SG respectively. The only factor that was a significant predictor in multivariate analysis of 30-day complication was prior cardiovascular disease OR 2.74, p 0.035 for BP patients, but not for those undergoing SG (OR 1.96, 0.210).
Conclusion(s): Our data did not support the use of the OS-MRS score in predicting 30-day complications of bariatric surgery. It may be time for nationally collected databases should be used to refine the role of the OS-MRS scoring system, or indeed provide an upgraded version.
Bariatrics—laparoscopic
O087—One anastomosis bypass for management of Diabetes type 2 – 7 years’ experience
Ivaylo Tzetkov1, Diana Mileva1, L Lozanov2, Em Kostadinov1, Sp Ivanov1
1Hospital Vita, General Surgery, 2Acibadem Tokuda University Hospital, Endocrinology, Bulgaria
One anastomosis gastric bypass (OAGB) is increasingly used for treatment of Morbid Obesity and Diabetes type 2 (DT2). Our retrospective study encompassed 7 years’ experience with application of OAGB for management of DT 2. Overall, 90 patients were included in the study, with history of DT2 less than 5 years, BMI between 50 and 56.0 and co-morbidity of hypertension, Sleep apnoea and arthritis. The laparoscopic technique included a sleeve of at least 15 cm and the biliary loop varied from 150 to 180 cm. All patients were followed up at least 2 years after surgery. The HbA1c varied from 7.0 to 8.5 before surgery, the age of patients was from 41 to 64 year’s old and the weight of the patients from 165 to 260 kg. Two patients had a conversion of Sleeve Gastrectomy to OAGB due to weight regain and unsatisfactory management of DT2. We performed review of partial and complete DT2 remission according to: sex; age; DT2 duration and baseline risk factors as: impaired fasting glucose (fasting glucose ≥ 7.0 mmol/L); combination of impaired glucose tolerance and fasting glucose; weight, BMI, lean body mass, total cholesterol, LDL cholesterol, HDL cholesterol, triglycerides, systolic and diastolic blood pressure.
The postoperative follow up showed full remission of DT2 in 41 patients with HbA1c less than 6.0% within five year after surgery. Another 37 patients had a significant improvement with HbA1c values from 6.0 to 6.5% after surgery till now and on one oral medication only. The rest 12 patients had HbA1c levels from 6.5 to 6.8% after surgery plus one oral medication or a low Insulin dose. The age group of those patient was from 58 to 64 years old and history of DT2 more than 3 years. Our data revealed that OAGB is safe and very efficient surgical option for management of DT2 in patients with Morbid Obesity.
Key words: Morbid Obesity, one anastomosis Gastric bypass, Diabetes Type 2.
Bariatrics—laparoscopic
O088—Concomitant hiatal hernia repair during bariatric surgery: does the reinforcement make the difference?
Cristian Eugeniu Boru1, P. Termine2, P. Antypas2, A. Iossa2, C. Ciccioriccio2, F. De Angelis2, A. Micalizzi2, G. Silecchia2
University La Sapienza of Rome, 1Division of General Surgery, 2Division of General Surgery & Bariatric Center of Excellence-IFSO EC, Italy
Background: Hiatal hernia repair (HHR) is still controversial during bariatric procedures, especially in case of laparoscopic sleeve gastrectomy (LSG). Aims: to report the long-term results of concomitant HHR, evaluating the safety and efficacy of posterior cruroplasty (PC), simple or reinforced with biosynthetic, absorbable Bio-A- mesh (Gore, USA). Primary endpoint: PC’s failure, defined as symptomatic HH recurrence, nonresponding to medical treatment and requiring revisional surgery.
Methods: the prospective database of 1876 bariatric operations performed in a center of excellence between 2011–2019 was searched for concomitant HHR. Intraoperative measurement of the hiatal surface area (HSA) was performed routinely. Results: A total of 250 patients undergone bariatric surgery and concomitant HHR (13%). Simple PC (group A, 151 patients) was performed during 130 LSG, 5 re-sleeves and 16 gastric bypasses; mean BMI 43.4–5.8 kg/m2, HSA mean size 3.4–2 cm2. Reinforced PC (group B) was performed in 99 cases: 62 primary LSG, 22 LGB and 15 revisions of LSG; mean BMI 44.6–7.7 kg/m2, HSA mean size 6.7–2 cm2. PC’s failure, with intrathoracic migration (ITM) of the LSG was encountered in 12 cases (8%) of simple vs. only 4 cases (4%) of reinforced PC (p = 0.23); hence, a repeat, reinforced PC and R-en-Y gastric bypass (LRYGB) was performed laparoscopically in all cases. No mesh-related complications were registered perioperatively or after long-term follow-up (mean 50 months). One case of cardiac metaplasia without goblet cells was detected 4 years postoperatively; conversion to LRYGB, with reinforced redo of the PC was performed. The Cox hazard analysis showed that the use of more than four stitches for cruroplasty represents a negative factor on recurrence (HR = 8; p < 0.05).
Conclusions: An aggressive search for and repair of HH during any bariatric procedure seems advisable, allowing a low HH recurrence rates. Additional measures, like mesh reinforcement of crural closure with biosynthetic, absorbable mesh, seem to improve results on long term follow-up, especially in case of larger hiatal defects. In our experience, reinforcement of even smaller defects seems advisable in obese population.
Bariatrics—laparoscopic
O089—Adjustable gastric banding conversion to one anastomosis gastric bypass in one and two stages: data analysis of a multicenter databe
Ozlem Uyanik1, Y Curbelo-Peña1, AI Al Abbas2, S Devriendt3, A Guerra4, MF Herrera5, J Himpens3, E Pardina6, S Pouwels7, A Ramos8, RJ Ribeiro9, B Safadi2, H Sanchez-Aguilar5, C De Vries10, B Van Wagensveld11, J Pujol-Rafols12
1Consorci Sanitari Alt Penedès i Garraf, General and Digestive System Surgery, Spain. 2American University of Beirut Medical Center (AUBMC), Beirut, General and Digestive System Surgery, Lebanon. 3AZ Sint Blasius, Dendermonde, Belgium and CHIREC Hospitals Brussels, Auderghem, General and Digestive System Surgery, Belgium. 4Centro Hospitalar de Lisboa Central, Lisbon, General and Digestive System Surgery, Portugal. 5Instituto Nacional de Nutrición, Centro Médico ABC, México City, General and Digestive System Surgery, Mexico. 6Facultat de Biologia, Universitat de Barcelona, Barcelona, Bioquímica i Biomedicina Molecular, Spain. 7Elisabeth-Tweesteden Hospital, Tilburg, The Netherlands, Intensive Care Medicine, The Netherlands. 8Gastro-Obeso-Center—Advanced Institute In Bariatric And Metabolic Surgery, Sao Paulo, General and Digestive System Surgery, Brazil. 9CLISA-Lusiadas, Amadora, Cirugia Geral e do Centro Multidisciplinar da Doença Metabólica, Portugal. 10OLVG-West, Amsterdam, General and Digestive System Surgery, The Netherlands. 11Quro Obesity Center, Dubai, General and Digestive System Surgery, United Arab Emirates. 12Clínica Mi Tres Torres, Barcelona, General and Digestive System Surgery, Spain
Aim: Formerly, laparoscopic adjustable gastric banding (LAGB) was one of the most popular bariatric surgery options, however many patients may require revisional surgery for weight regain or mechanical complications. One anastomosis gastric bypass (OAGB) has been proposed as a rescue procedure for failed LAGB, but to date, whether to accomplish in one or two stages is still a controversial topic. The aim of this study to analyze the outcomes of LAGB-to-OAGB conversion in one and two stages.
Methods: Revision of retrospective data analysis of a multicenter database. The results of patients converted from LAGB to OAGB in one or two stages with special emphasis on complications, leak rate, hemorrhage, mortality and weight loss were compared.
Results: Data from 189 LAGB to OAGB operations were analyzed. Eighty-seven (46.0%) were one stage conversions. Patients operated on in two stages had a higher preoperative body mass index (BMI) (37.9 vs. 41.3 kg/m2, p = 0.0007) and were more likely to have encountered technical complications, such as slippage or erosions (36% vs. 78%, p < 0.0001). Postoperative complications occurred in 4.6% and in 4.9% of the patients in the one-stage and the two-stage group respectively (p = 0.92). Leak rate, bleeding episodes and mortality were not statistically different between the one-stage and the two-stage group (1.1% vs. 3.9%, 1.1% vs. 0.0% and 0.0% vs. 1.0% respectively). Final BMI was equivalent for the one and the two-stage groups (30.4 and 30.1 kg/m2 respectively, p = ns) at a mean follow-up of 31.4 months. Follow-up at 1, 3 and 5 years was 100%, 88% and 70%, respectively.
Conclusion: Conversion from LAGB to OAGB is safe and effective. The one-stage approach appears to be the preferred option in non-complicated cases. These findings suggest the importance of a good patient assessment when considering the conversion approach.
Bariatrics—laparoscopic
O090—Does pre-operative glycaemic control predict 30-day complication in those undergoing bariatric surgery?
Thomas Chase1, H. Malik2, K. Theodoropoulou1, S. Agrawal2, K Devalia2, A. Goralczyk2, R. Aguilo2, Y. Koak2, J. Loy2, W. Lynn3
Homerton University Hospital, 1General Surgery, 2Bariatric Surgery, 3Maidstone and Tunbridge Wells NHS Trust, Surgery, United Kingdom
Aims: Poorly controlled diabetes is recognised risk factor for complications in thoracic, colorectal and general surgical procedures. Although it is unclear if there is a similar association in bariatric surgery. This becomes pertinent when we consider the one of the goals of bariatric surgery to ease the burden of anti-glycaemic agents and diabetic complications; and pre-operative control may never be ideal. To that end we set out to determine if there is an association between poor pre-operative glycaemic control (HbA1c) and increased complications.
Methods: A retrospective longitudinal cohort study included all patients who underwent bariatric surgery at a single major centre in the UK between Jul 2014 and Dec 2018 were included. Cases were further subdivided into those undergoing gastric bypass (BP) and sleeve gastrectomy (SG). Primary outcomes measured were all 30-day complications. Univariate and multivariate regression analysis (controlling for confounders of initial BMI, smoking, hypertension, cardiovascular disease and obstructive sleep apnoea) was conducted looking at whether elevated pre-operative HbA1c, defined as HbA1c > 6.5%, predicted 30-day complications. Further subgroup analysis was also performed.
Results: 1076 patients (244 males, mean age 46) were included of which 473 underwent BP (120 single anastomosis gastric bypass and 353 Roux-en-Y gastric bypass) and 603 had SG. The pre-operative BMI of those undergoing BP and SG was 47.4 and was 49.8 respectively. 391 patients in total had T2DM including 198 (42%) in the GPB subset and 193 (32%) in the SG cohort. For both GB and SG, preoperative HbA1c was not a significant predictor of 30-day complications (p = 0.753 or 0.955 for univariate or multivariate analysis). Within the subset of diabetic patients only, HbA1c > 6.5% was also not a predictor of 30-day complications.
Conclusion(s): Pre-operative poor glycaemic control is not a predictor of 30-day morbidity within patients undergoing bariatric surgery. Therefore, consideration should be made as to the value of delaying surgery to optimise glycaemic control in those undergoing such operations.
Bariatrics—laparoscopic
O135—Is single anastomosis gastric bypass with fixed common channel length is effective and safe as standard mini gastric bypass?
Sherif Albalkiny
Ain Shams university Hospital, General surgery, Egypt
Background: Although Mini gastric Bypass led to a safe considerable weight loss in most patients, but still there is weight regain or unsatisfied weight loss, occurred in about 13% of patients, moreover, 0.5% develops malnutrition requiring surgical correction(1).The main cause behind is that the small intestinal length is very variable, and in standard MGB the common channel length is not measured, and there is a strong evidence support the degree of malabsorption after gastric bypass surgery is influenced mainly by the length of common channel(2).
Methods: Prospective randomized study included 60 obese patients who underwent Laparoscopic MGB surgery between March 2016 and March 2018 and assigned into two groups, Group I underwent Standard MGB and Group II underwent single anastomosis Gastric bypass with fixed common channel length of 300 cm.
Results: Both groups have satisfactory EWL; however, EWL is steadier in group II, Mean percentage of EWL reported after one year was 67% ± 6 in Group I while in Group II was 70% ± 1.47 with (P-value 0.453). With less incidence of nutritional deficiencies in-group II.
Both groups have significant improvement of preoperative co morbidities. for instance: (36.7%) of Group I and (50%) of group II showed improvement of their diabetes status ( p-value 0.297) and about 33.3% of Both Group I& II showed improvement of their blood pressure.
In addition, Malodorous flatus affecting social life was more frequent in-group II than in group I with (P-value 0.001); however, this has not affected their quality of life estimated by BAROS.
Conclusion: In performing single anastomosis Gastric bypass with fixed common channel length achieves satisfactory maintained EWL with less possible metabolic complications.
Bariatrics—laparoscopic
O136—Do laparoscopic transversus absominis plane block and rectus sheath blocks reduce post-operative opioid consumption in gastric bypass patients? RCT
Amer Jarrar1, A. Budiansky2, N. Eipe2, C. Walsh1, N. Kolozsvari, 1 A. Neville1, J.D. Yelle1, J. Mamazza1
The Ottawa Hospital, 1Department of Surgery, 2Anesthesia, Canada
Aims: Management of postoperative pain remains a significant challenge and an area of continued research, Postoperative pain management is typically opioid-based; however, postoperative opioid use may be associated with increased risk of respiratory depression and sedation. Given the increasing number of patients with morbid obesity presenting for elective weight loss surgery, it is crucial to understand and optimize the analgesic requirements of this patient population. This study aims to evaluate the efficacy of a laparoscopically-guided, surgical transversus abdominis plane (TAP) block and rectus sheath block (RS) in reducing postoperative opioid consumption and improving outcomes in patients undergoing laparoscopic gastric bypass surgery.
Methods: One hundred fifty morbidly obese patients undergoing elective laparoscopic Roux-En-Y gastric bypass (LRYGB) for obesity were recruited to this double-blinded, placebo-controlled Randomized Control Trial from a Bariatric Centre of Excellence. Patients were electronically randomized on a 1:1 basis to either an intervention or placebo group. Those on the intervention arm received a total of 60 mL 0.25% ropivacaine, divided into four injections: two for TAP and two for RS block under laparoscopic visualization. The placebo arm received normal saline (NS) in the same manner. A standardized surgical and anesthetic protocol was followed, with care in adherence to the Enhanced Recovery after Bariatric Surgery (ERABS) guidelines. Our primary efficacy endpoint was cumulative 24-h postoperative opioid use. Secondary outcomes were peak expiratory flow (PEF), Postoperative pain score and the 6-min walk test. Quality of recovery will be assessed using a validated questionnaire (QoR-40). Statistical analysis was conducted to determine differences within and between the two groups. The repeated measures will be analyzed by a mixed modelling approach in the final analysis.
Results: Preliminary analysis has shown no reduction in the 24-h postoperative morphine equivalence of opioids administered to the intervention group in comparison to the placebo group ( 22.2 mg vs 21.3 mg, p = 0.45), analysis of the remaining outcomes is pending.
Conclusion: The use of TAP and Rectus sheath blocks in LRYGB does not reduce postoperative opioid consumption in the 24 postoperatively. Further analysis of different time points and secondary outcomes is required.
Bariatrics—laparoscopic
O137—Relapse of diabetes after Roux-en-Y gastric bypass for patients with obesity: 12 years follow up study
Ahmed Elshaer, M.Q. Almerie, M. Pellen, P. Jain
Hull University Hospitals, Upper GI surgery, United Kingdom
Aim: Roux-en-Y gastric bypass (RYGB) is a recommended treatment for type 2 diabetes mellitus (T2DM) in patients with obesity, with superiority over medical therapy. While diabetes remission is achieved initially in 60%-90% of patients following surgery, many may experience relapse of diabetes on the long-term. Data on long-term follow up of bariatric surgery is scarce. We report this 12-year follow up study of glycaemic control following RYGB.
Methods: 217 patients with obesity (109 diabetic, 108 matched non-diabetic) who underwent RYGB between 2000 and 2008 were identified. Data was recorded prospectively for these patients at baseline and 2 years post-operatively. The long-term data was obtained via direct contact with the patients cross-checked with our hospital/national patients’ electronic databases.
Results: The follow-up rate was 88% (initial age 44 ± 9 years, female 79%). The mean(± SD) percentage total weight loss was 28% (± 15%) and 27% (± 17%) at 2 years and 12 years, respectively. Diabetes remission rate was 69% at 2 years, but decreased to 36% at 12 years following surgery. The 12-year incidence of new-onset T2DM in the control group was 4.3%. On univariate analysis, age, preoperative duration of diabetes and use of insulin were associated with less chance of diabetes remission at long-term (p value 0.06, 0.01 and 0.03, respectively). However, on multivariate regression analysis; only the duration of diabetes preoperatively remained significant (p = 0.025).
Conclusion: This study shows a high relapse of diabetes 12-year post-RYGB despite the durability of weight loss. This affects pre-operative counselling and indicates a need for a longer follow-up to detect relapse. Moreover, the study supports that short duration of preoperative diabetes is the main factor that corresponds significantly to a higher rate of long-term remission.
Bariatrics—laparoscopic
O138—Transhiatal migration after LSG myth or reality? A multicenter, retrospective study on the incidence and clinical impact
Cristian Eugeniu Boru1, P. Termine1, A. Iossa1, C. Ciccioriccio1, M. Campanelli2, P. Gentileschi2, G. Silecchia1
1University La Sapienza of Rome, Division of General Surgery & Bariatric Center of Excellence-IFSO EC, 2San Carlo di Nancy Hospital, Rome, Division of General & Metabolic Surgery, Italy
Introduction: Intra-thoracic migration (ITM) represents an unacknowledged complication after sleeve gastrectomy (LSG), anecdotical reported, and contributes to the development of gastroesophageal reflux disease (GERD), both recurrent and de novo. The primary end point of this study was to evaluate the incidence of postoperative ITM- 2 cm; secondary end point was to determine the relationships between ITM, GERD, endoscopic findings and the percentage of patients requiring surgical revision.
Materials and Methods: A retrospective, multicenter study on prospective databases was conducted, analyzing LSGs performed between 2013 and 2018. Inclusion criteria consisted in primary operation; BMI raging 35–60 kg/m2, age between 18 and 65 years, minimum follow-up 24 months and postoperative EGDS, excluding concomitant hiatal hernia repair. Esophageal manometry and 24-h pHmetry were indicated based on postoperative questionnaires and EGDS; patients with GERD due to ITM, non-responders to medical therapy, were converted to R-en-Y Gastric Bypass (RYGB).
Results: An ITM 2 cm was postoperative diagnosed in 94 patients (7% of 1337 LSGs), after mean 24.16–13.6 months. Postoperative esophagitis was found in 29 patients vs. 15 initially statistically significant different (p = 0.001), while GERD was demonstrated in 75 (vs. 20 preoperatively, p < 0.001). Fifteen patients (16%) underwent revision to RYGB with posterior cruroplasty. 17 patients with severe GERD presented improvement of endoscopic findings and clinical symptoms under conservative therapy.
Conclusions: ITM after LSG is not a negligible complication and represents an important pathogenic factor in development or worsening of GERD. Postoperative EGDS plays a fundamental role in diagnosis of esophageal mucosa’s lesions.
Bariatrics—laparoscopic
O139—Laparoscopic bariatric surgery is safe during phase 2–3 of Covid-19 pandemic in Italy: a multicenter, prospective, observational study
Boru Cristian Eugeniu1, G. Silecchia1, G. Marinari2, P. Gentileschi3, M. Morino4, S. Olmi5, M. Anselmino6, M. Foletto7, P. Bernante8, C. Tascini9, R. Morganti10
1University La Sapienza of Rome, Division of General Surgery & Bariatric center of Excellence IFSO-EC, 2Humanitas Clinical and Research Center, Division of Bariatric Surgery, 3San Carlo of Nancy Hospital and “Tor Vergata” University of Rome, Department of Bariatric and Metabolic Surgery, 4University of Turin, Department of Surgical Sciences, 5Policlinico San Marco di Zingonia, General and Oncological Surgery Department, 6Azienda Ospedaliera at University of Pisa, Bariatric and Metabolic Surgery Unit, 7Azienda Ospedaliera of Padova University, Week Surgery Division8Azienda Ospedaliera of Bologna University, Bariatric Surgery Department, 9University of Udine, TSCO Infective Diseases Department, 10University Hospital of Pisa, Section of Statistics, Italy
Background: Sars-Cov-2 epidemic in Italy caused one of the greatest of European outbreaks of 2020, with the immediate suspension of elective bariatric/metabolic surgery (BMS). From May 2020 a sensitive decline of the COVID-19 epidemic has been observed (phase 2); Italian National/Regional Health Service’s protocols permitted the resumption of elective BMS. A new, more severe COVID-19 surge, considered as the second wave, started October 2020 (phase 3). Aim: the primary end point was to analyze the results of any Sars-Cov-2 infection and related morbidity/mortality within 30 post-operative days after laparoscopic BMS during phase 2–3; secondary end points were readmission and reoperation rates.
Methods: Study design prospective, multicenter, longitudinal observational. Setting: Eight Italian high-volume bariatric centers. All patients undergoing BMS during July 2020 – January 2021 were enrolled under the following criteria: no previous Sars-Cov-2 infection; primary standard procedures; no concomitant procedure; > 18 < 60 years old; compensated comorbidities; informed consent including COVID-19 addendum; adherence to specific admission, in-hospital, operating theatre, and follow-up protocols. Data were collected in a prospective, online database. Patients undergoing BMS during July-December 2019 were considered a control matched group.
Results: 1258 patients were enrolled against 1451 operated on in 2019, with no differences for demographics, complications, readmission, and reintervention rates. Eight patients (0.6%) and 15 healthcare professionals tested positive for Sars-Cov-2 infection, with no related complications or mortality.
Conclusions: Introduction of strict COVID-19 protocols concerning the protection of patients and health-care professionals guaranteed a safe resumption of elective BMS in Italy. The safety profile was, also, maintained during the second wave of outbreak, thus allowing access to a cure for the obese population.
Bariatrics—laparoscopic
O171—Analysis of national bariatric surgery related clinical incidents
Islam Omar1, C. Parmar2, O. Khan3, M. Wilson4, B. Madhok5, K. Mahawar1
1Sunderland Royal Hospital, South Tyneside and Sunderland NHS Trust, Bariatric Unit, Department of General Surgery, 2Whittington Health NHS Trust, UGI Surgery, 3St. George's University Hospitals NHS Foundation Trust, Upper GI Surgery, 4NHS Forth Valley, Larbert, Scotland, UK, Upper GI Surgery, 5Royal Derby Hospital, University Hospitals of Derby & Burton NHS Foundation Trust, General and Upper GI Surgery, United Kingdom
Background: Hundreds of thousands of patient-safety clinical incidents are reported to the National Reporting and Learning System (NRLS) database in the United Kingdom every year. The purpose of this study was to identify learning points from bariatric surgery-related clinical incidents.
Methods: We analysed bariatric surgery-related clinical incidents reported to the NRLS database between 01 April 2005 and 31st October 2019.
Results: We outline here 541 incidents. Preoperative incidents represented 30.31% (N = 164), intraoperative were 38.09% (N = 206), and postoperative accounted for 31.61% (N = 171).
Overall high severity incidents included 150 incidents representing 27.7% of the total. Medium and low severity incidents represented 45.1% and 27.2% of the total with 244 and 147 incidents respectively.
The most common theme was unavailable or faulty equipment, instruments or infrastructures with 93 incidents representing 17.2% of the total incidents. This was followed by (50; 9.2%) incidents of VTE problems and (45; 8.32%) incidents of wrong medication prescription or dosage or prescription of contraindicated medications. The fourth most common problem was inappropriate management of diabetes postoperatively with 35 incidents representing 6.5%. There were 29 incidents of HDU/ICU Beds problems, 26 occasions of patients’ routine medications or blood thinner bad management, and 23 incidents of postoperative diet problems representing 5.4%, 4.8% and 4.3% respectively.
Conclusion: This analysis identified 541 incidents under 4 main categories and highlighted the most common themes. Awareness of these themes might help reduce their incidence. We proposed a bariatric safety chart which would help avoid recurrence of these incidents in the future.

Bariatrics—laparoscopic
O199—Influence of the gastric tube size on the incidence of postoperatory gastroesophageal reflux after laparoscopic sleeve gastrectomy
Eulalia Ballester, B. Gonzalo, S. Fernandez, C. Codina, A. Basterra, C. Balagué
Hospital de la Santa Creu i Sant Pau, General Surgery, Spain
Background and Aims: Laparoscopic sleeve gastrectomy (LSG) has enormously grown in popularity as a stand-alone procedure for the treatment of morbid obesity. Technical aspects of this procedure have been progressively established, mostly by empirical observation. The aim of this study is to offer scientific basis to the lack of evidence on the matter of the antrum size or the bougie diameter and its relation with gastric emptying (GE) and gastroesophageal reflux and, definitively, their implication in weight loss outcomes.
Study Design: Randomized Control Trial (NCT02144545) was designed to analyse the effect of two factors: bougie size (33 vs 42Fr) and distance between the pylorus and the beginning of sleeve (2 cm vs 5 cm). Using the two factors, patients diagnosed of severe obesity with indication of LSG were randomized in 4 groups: 1 (33Fr and 2 cm); 2 (33Fr and 5 cm); 3 (42Fr and 2 cm); 4 (42Fr and 5 cm).
Gastric emptying scintigraphy, 24H pHmetry and barium swallow test were performed preoperatively, 2 months, and 1 year after surgery in those patients. Parameters were compared to percentage of excess weight loss (%EWL) at 1 year.
Results: 74 patients were included in the study. Females accounted for 75.8% of patients. Mean age was 49.7 years. Mean preoperative BMI was 42 kg/m2.
The preoperative %GE after 1 h mean was 57% ± 27 in 2 cm group and 56% ± 23 in the 5 cm group (p > 0.05). At 2 months after LSG the mean %GE was 70% ± 17 in the 2 cm group and 66% ± 17 in the 5 cm group (p > 0.05). At 1 year it was 65% ± 22 and 67% ± 17 in the 2 cm and 5 cm groups, respectively (p > 0.05). A significant accelerated gastric emptying was observed at 2 months (p = 0.03) in the 2 cm group. Meanwhile in the 5 cm group this increase was not significant (p > 0.05 at 2 months and 1 year).
The preoperative mean 24hpHmetry register in distal channel (calculated as % of time the distal channel has a pH < 4) was 0.03 and 0.07 in 33Fr and 42Fr group respectively (p > 0.05). At 2 months the mean was 0.13 and 0.08 and at 1 year was 0.12 and 0.17 respectively. No statistically differences were found between groups (p > 0.05) but the increase in pathological reflux was significant in both groups (p = 0.03).
Differences regarding the %EWL at 1 year between groups were no statistically significant (p > 0.05).
Conclusions: After the LGS we found a global acceleration in the gastric emptying that showed significance in the 2 cm group (antrum resection). At 1 year an increase of the gastroesophageal reflux was observed in both groups without differences depending of bougie’s size. No significant differences in %EWL at 1 year were found between the four groups.
Bariatrics—laparoscopic
O277—Effect of intraperitoneal local anesthetic on enhanced recovery outcomes following bariatric surgery: a randomized controlled pilot study
Amer Jarrar1, N. Eipe2, R. Wu1, A. Neville1, J.D. Yelle, 1 J. Mamazza1
The Ottawa Hospital, 1Department of Surgery, 2Anesthesia, Canada
Aims: Patients with morbid obesity are at a high risk of adverse perioperative events, especially when using opioid-centric analgesic protocols. Perioperative pain management interventions in bariatric surgery could improve safety, outcomes, and satisfaction, We aimed to evaluate the impact of intraperitoneal local anesthetic on enhanced recovery after 30 bariatric surgery (ERABS) outcomes.
Methods: We conducted a prospective, double-blind, randomized, controlled pilot study in adherence to 35 an a-priori peer reviewed protocol. A total of 120 patients undergoing laparoscopic Roux-en-Y gastric bypass surgery (LRYGB) with an established ERABS protocol were randomly allocated to the study group (intraperitoneal ropivacaine, 0.2% 100 mL) or the control group (normal saline 100 mL). We measured pain scores, analgesic consumption, side-effects. Functional prehabilitation outcomes, including a 6-min walk test (6MWT), peak expiratory flow (PEF), 40 and quality of recovery (QOR-40) scores, were assessed upon follow-up.
Results: Ninety-two patients undergoing LRYGB were included for final analysis with 46 patients in each group. There were no statistically significant differences between the two groups in baseline characteristics, demographics, or any primary or secondary outcomes. Pain Scores and analgesic consumption were low in both groups with there were no adverse events. A significant decline in 6MWT, PEFR, and QOR-40 were noted in the first 24 h, which returned to baseline on the 7th postoperative day in both groups.
Conclusion: IPLA (ropivacaine) did not reduce postoperative pain or analgesic consumption when administered intraoperatively to patients undergoing LRYGB. ERABS protocol standardization benefited patients with functional prehabilitation outcomes returning to baseline.
Bariatrics—physiology
O187—Maternal and fetal outcomes of asian pregnancies after bariatric surgery
Sajid Malik, A. Shabbir, D. Lomanto
National University Hospital, Minimally Invasive Surgery, Singapore
Introduction: Obesity is a risk factor for high risk pregnancies with a higher incidence of pregnancy-induced hypertension (PIH), Pre-Eclampsia (PE), Gestational Diabetes Mellitus (GDM) and Large Gestational Age (LGA) pregnancy. Bariatric surgery is widely accepted to treat obesity but is associated with small for gestational age (SGA) fetuses.
Objective: To report maternal and fetal outcomes following bariatric surgery in morbidly obese Asian females.
Setting: University Hospital, Singapore.
Methods: We maintain a prospective cohort of patients who underwent bariatric surgery in our institution. Maternal and fetal outcomes are compared to a control group of 31 pregnancies matched for age, parity, pre-surgery weight and year of delivery.
Results: 19.3% and 32.2% of morbidly obese women in the control group developed GDM and PIH/ PE respectively compared to 5% patients who developed GDM and none developing PIH or PE in the post bariatric surgery group. Bariatric surgery was protective against LGA infants and resulted in lower incidence of PIH. 37.5% of foetuses in the bariatric group had low birth weight compared to only 3 out of 31 foetuses in the control group (9.4%, p = 0.016). Pre-operative Body Mass Index (BMI), short interval between conception and surgery and poor weight gain during pregnancy did not predict for SGA fetuses.
Conclusion: Bariatric surgery lowers the risk of maternal co-morbidities and LGA fetus during pregnancy. Asians are at high risk of SGA pregnancies after bariatric surgery and we suggest that obstetricians and bariatric surgeons work closely with post bariatric surgery women to determine the ideal time for pregnancy and encourage close monitoring for fetal growth throughout their pregnancy.
Keywords: Maternal, Fetal, Obesity, Laparoscopy, Bariatric.
Bariatrics—robotics
O114—Robotic assisted Roux-en-Y gastric bypass: technology and learning evolution
Berta Parés1, R. Vilallonga2, J.M. Fort López-Barajas2, R. Roriz2, A. García Ruiz de Gordejuela2, E. Caubet Busquet2, O. González López2, A. Ciudin2, L. Vidal1, M. Pera1, Manel Armengol Carrasco1
Vall d’Hebron University Hospital, 1General Surgery, 2Endocrine and Metabolic and Bariatric Unit, Spain
Aim: The aim of this study was to compare the laparoscopic Roux-en-Y gastric bypass (L-GBP) with robotic Roux-en-Y gastric bypass (R-GBP) performed with two different generations of Da VinciTM System, S and Xi, (R-GBP-S and R-GBP-Xi respectively).
Method: A retrospective cohort study was made from a prospective database including patients who underwent a GBP between January 2011 and December 2018.
The main technical difference between both approaches was the gastrojejunostomy as in the robotic group was hand-sewn two-layers whereas in the laparoscopic group it was semimechanical.
Variables analysed were time of surgery, complications, length of stay and mortality. All patients had a follow-up period with body mass index (BMI) and percent of total weight loss (%TWL) records.
Statistical analysis was done using IBM® SPSS® Statistics software version 24.0. Confidence interval was at 95%. A two-sided P value ≤ 0.05 was considered with statistical significance.
Results: 495 patients were divided in three groups: 224 (45,2%) in L-GBP, 174 (35,1%) in R-GBP-S (from 2011 to 2015) and 134 (27%) in R-GBP-Xi (from 2015 to 2018) 71.1% of the patients were females with a mean age of 46.2 years and mean BMI of 44 kg/m2. 30-days outcomes. The mean operative time for robotic approach was significantly higher than that on the laparoscopic group. The higher rate of major complications appeared on the R-GBP-S group. The anastomotic leak of the upper part of the gastrojejunostomy was the most frequent complication identified on this group. Follow-up Period. Postoperative and chronic complications were more common in the L-GBP and the R-GBP-S group. The following-up period was shorter in the R-GBP-Xi group. The R-GBP-Xi group had the highest mean of BMI change during the first year in contrast to the lowest BMI change during the second year in the same group.
Conclusion: We believe that laparoscopic and robotic approaches might have had similar results if we did not take into account the learning curve for robotic procedures and if we did not use the robotic S generation, considering the potential problems caused by its instrument features. A homogeneous follow-up period for all groups would have been mandatory.
Colorectal—benign
O019—Hartmann’s procedure versus sigmoidectomy with primary anastomosis for perforated diverticulitis: three-year follow-up of the Ladies trial
Vincent T. Hoek1, Pim P. Edomskis1, P.W Stark1, D.P.V Lambrichts1, W. Draaisma2, E.C.J. Consten3, W.A. Bemelman4, J.F. Lange1
1Erasmus University Medical Centre, Surgery, 2Jeroen Bosch Hospital, Surgery, 3Meander Medical Centre, Surgery, 4Amsterdam University Medical Centre, Surgery,—The Netherlands
Aim: The aim of the present study is to present the three years follow-up of the DIVA arm of the LADIES trial (RCT) that compared Hartmann’s Procedure (HP) with sigmoidectomy with primary anastomosis (with or without defunctioning ileostomy) (PA) in a randomized design to determine the optimal treatment strategy for perforated diverticulitis with purulent or faecal peritonitis.
Methods: Data were prospectively gathered for the first 12 months after randomization and retrospectively collected up to 36 months. The primary long-term endpoint was stoma-free survival 36 months after the index procedure. Secondary outcomes were patients with a stoma at 36 months, percentage of stoma reversals, related reinterventions, parastomal/incisional hernia rates, total in hospital days including all readmissions regardless their relation to the intervention, overall morbidity and mortality.
Results: Three years follow-up was completed in 119 of the originally 130 included patients, with 57 (48%) in the PA-group and 62 (52%) patients in the HP-group. 36 months stoma-free survival was significantly better for patients undergoing PA compared with HP (PA 92% vs HP 81%, hazard ratio 2·326 [95% CI 1·538–3.517]; log-rank p < 0·0001).
Stoma reversal rates did not significantly differ (PA 31/40(77.5%) versus HP 45/61(73.8%), p = 0.814). Overall cumulative morbidity (PA 21/57(36%) versus HP 30/62(48%), p = 0.266) and mortality (PA 6/57(11%) versus HP 7/62 (11%), p = 1.000) did not differ between groups. The mean total in hospital days after three years follow-up was significantly lower in the PA-group compared to the HP-group (PA 14 days (IQ 9.5- 22.5 versus HP 17 days (IQ 12.5 – 27.5)), p = 0.025).
Conclusion: Long-term results showed that in haemodynamically stable, immunocompetent patients younger than 85 years, primary anastomosis is superior to Hartmann’s procedure as treatment for perforated diverticulitis with respect to long-term stoma rate and overall hospitalization.
Colorectal—benign
O020—Management and evolution of acute diverticulitis with pericolic free gas (ADiFas): outcomes of a multicentre international study
Patricia Tejedor1, C. Carlos2, N. Francis3, M. Gorter-Stam4
1University Hospital 'Gregorio Marañón', Colorectal Surgery, Spain, 2University Clinic of Navarre, Colorectal Surgery, Spain, 3Yeovil District Hospitals NHS Foundation Trust, Colorectal Surgery, United Kingdom, 4Amsterdam UMC, Colorectal Surgery, The Netherlands
Aims: There is no evidence to guide the management of patients diagnosed with acute diverticulitis (AD) with pericolic free gas, but without free air or abscesses. We aim to study the management of patients with this condition and report on the short-term outcomes in a multicentre international study.
Methods: Patients diagnosed with AD confirmed on a CT scan were prospectively enrolled in this study. Data collected on the modality of treatment (surgery, interventional therapy or conservative therapy). We also captured data on treatment failure, which included readmission and/or rescue operative or interventional strategy.
Primary outcome was the rate of interventions. Secondary outcomes included length of stay, 30-day readmission and complications.
Results: A total of 505 patients from 58 worldwide centres were included. 458 patients were treated conservatively: 416 (91%) were hospitalized for intravenous antibiotics, while the remaining 42 (9%) were treated as ambulatory cases. 395 (86.2%) were successfully treated with antibiotics without requiring any intervention or readmission, while 42 (9%) patients required readmission, 11 (2.4%) patients needed percutaneous drainage and 10 (2.2%) patients required surgery as a secondary option. The rate of failure was 13.8%.
47 (9%) patients underwent initial surgery (23 open, 18 laparoscopic and 6 robotic). The most common modalities of surgery involved resection and primary anastomosis (n = 17, 36%), followed by Hartmanns’ procedure (n = 13, 28%) and laparoscopic lavage (n = 12, 25.5%). 11 (23.4%) patients had minor postoperative complications and 9 (19.2%) patients developed major complications, including one who died. The rate of failure was 17%.
Conclusions: Preliminary results showed that patients with acute diverticulitis and pericolic free gas can be successfully treated by conservative therapy, but the majority required hospitalisation.
Surgical intervention is associated with a high complication percentage and a considerable failure rate.
Colorectal—benign
O021—Routine colonoscopy after CT diagnosed diverticulitis: is it still necessary? A single Irish centre experience and literature review
Mohamed Salama1, A. Kazi2, A. Salama3, H. Babur4, I. Ahmed1
1Our Lady of Lourdes Hospital, General Surgery, Ireland, 2St Vincent's University Hospital, Ireland, 3NUI Galway, Ireland, 4Plovdiv Medical University, Bulgaria
Introduction: The prevalence of diverticular disease and colorectal cancer has markedly increased in the past century. Routine colonoscopy 6 weeks after resolution of CT diagnosed acute diverticulitis is widely accepted practice amongst general surgeons. Modern 64 to 128 slice CT have questioned the need for routine colonoscopy after an acute attack of acute diverticulitis however most of the current international guidelines recommend routine colonoscopy after conservative management of acute diverticulitis but data to support these recommendation are sparse, conflicting and so it may require further studies. Aims: 1) To review the current practice of routine colonoscopy at our institution after resolution of acute diverticulitis diagnosed by CT 2) To quantify its diagnostic value 3) To establish whether routine follow-up with colonoscopy is necessary for all patients following acute diverticulitis diagnosed with CT. Methods: We performed a retrospective study of patients with acute diverticulitis via our HIPE system from Jan 2016 to Dec 2017 in our unit. We reviewed their CT reports via NIMIS and their follow-up colonoscopies via ENDORAAD within one year of diagnoses and their pathology results. We compared the findings identified at colonoscopy and CT reports to determine the prevalence of colonic tumours and polyps in patients with acute diverticulitis. Results: 258 patients included in our study (male 124, female 134) with age range between 18 and 99 years All patients had CT diagnosed diverticulitis. Colonoscopy performed on 201 [78%] patients within one year and the rest had no colonoscopy (very old, very young or refused colonoscopy). 17 cases had polyps, histology confirmed tubulovillous adenoma with low grade dysplasia or no dysplasia (adenoma detection rate 8.5%) 2 cases diagnosed with colonic tumour (2%):—1st case: CT reported stricture ?diverticular disease vs tumours: colonoscopy showed sigmoid tumour and confirmed histologically.—2nd case: CT reported sealed perforation ?diverticular ?tumour: colonoscopy showed sigmoid tumour and confirmed histologically. 82 cases colonoscopy reported as only diverticulosis. Conclusions: Our study and recent evidence suggest routine colonoscopy after CT diagnosed diverticulitis does not appear necessary unless there are concerning symptoms or CT findings and patients of screening age with no previous colonoscopy.
Colorectal—benign
O022—A case report of concurrent perforated acute sigmoid diverticulitis and perforated acute appendicitis
Colum O'Reilly, B Murphy, G Orsi, M Aremu, N Ozoani, K Subramanian, K Macauley
Connolly Hospital, Surgery, Ireland
Introduction: Acute appendicitis and acute diverticulitis together are responsible for the majority of intra-abdominal infections seen in the emergency setting in the western world. Both pathologies share many epidemiological similarities, suggesting a common underlying pathogenesis. Extensive literature review reveals a paucity of studies reporting concurrent intraoperative findings of both conditions and this is the first report of these concurrent pathologies reported in the western literature as far as we know.
Method: We report the case of a 30-year-old gentleman presenting with a 2-day history of bloody diarrhoea, vomiting and abdominal pain with associated supraventricular tachycardia and 2 syncopal episodes. No previous relevant medical, surgical or family history. On examination, he was dehydrated, Pulse—180/min, BP -120/98 mmHg, Resp rate -36/min, Temp -38.4 °C. Abdominal examination revealed generalised tenderness and guarding.
Result: Blood investigations showed Hb—14.2 g/dl, WBC—9.6 × 109/L, CRP—310 mg/dL, Urea—5.1 mmol/L, Creatinine—131 μmol/L, Lactate—4.09 mmol/L. Abdominal/Pelvic CT (Figure A + B) showed perforated acute sigmoid diverticulitis. He was placed on broad spectrum antibiotics (IV cefuroxime + gentamicin) and intravenous fluids and was taken to theatre. Laparotomy revealed generalised purulent peritonitis, pelvic abscess, severely diseased sigmoid with associated severe diverticulitis and inflammed appendix. Hartmanns procedure and appendicectomy was performed (Figure C). Histology confirmed perforated sigmoid diverticulitis and perforated acute appendicitis (Figure D). Patient discharged eighth day post-operatively with surgical OPD and stoma nurse follow up.
Conclusion: The paucity of studies reporting synchronous acute appendicitis and diverticulitis in the literature is surprising given their high incidences. Clinical examination, laboratory and radiological investigations are key tools in the diagnostic process. Both pathologies occurring in a 30-year old highlights the changing demographic age-profile of acute diverticulitis. Furthermore, the initial hypothesis that appendicitis was a reactive phenomenon secondary to perforated diverticulitis was not supported on histological analysis, inferring that both pathologies were present concurrently. This may be due to shared aetiological factors for these diseases. Importantly, this case highlights the necessity for thorough investigation of the abdomen during both laparoscopy and laparotomy in the emergency setting and the potential mistake of assuming only one pathology may be present.


Colorectal—benign
O023—Acute complicated appendicitis caused by an ingested toothpick—A Case Report
Angus Lloyd, S.M. Abd Elwahab, C. Power
Beaumont Hospital, Department of General Surgery, Ireland
Introduction: Acute appendicitis is one of the most common presentations to the emergency department, particularly in young adults. A combination of clinical suspicion, inflammatory blood markers and imaging modalities such as ultrasound and CT are used for its definitively diagnosis. Early detection and intervention are paramount to reduce morbidity and mortality. Appendicitis is typically caused by a luminal obstruction secondary to a faecolith, lymphoid hyperplasia or neoplasm. However, there are over 200 cases reported in the literature that show in rare circumstances, acute appendicitis can be caused by the ingestion of a foreign body.
Case Summary: This case report describes a rare presentation of acute appendicitis caused by an ingested toothpick in a 64 year old woman. The patient was admitted with a 3 day history of lower abdominal pain, localising to the right iliac fossa with raised inflammatory markers. CT imaging reported acute complicated appendicitis associated with appendiceal perforation with radiopaque object visible (Fig. 1). A laparosopic appendicectomy was performed during which a tootpick was discovered protruding through the appendiceal wall (Fig. 2). The patient reports no memory of ingesting the toothpick. Post operatively the patient was treated with IV antibiotics as an inpatient for 5 days prior to discharge. Patient was followed up six weeks later in outpatient clinic. She had recovered well and had normal blood test results.
Discussion: According to EAES guidelines, appendicectomy remains the gold standard in the management of both uncomplicated and complicated acute appendicitis. However in the case of acute appendicitis secondary to foreign body ingestion, surgical intervention to remove the foreign body is paramount with no scope for conservative management. Laparoscopic appendicectomies are associated with reduced post-operative complications, shorter post-operative hospital stays, earlier return to normal activity but a longer operation time in comparison to open appendicectomies. Due to the rare nature of acute appendicitis secondary to foreign body ingestion there are no specific guidelines on the respective surgical approach. Therefore it is likely that surgical approach is based on the clinical judgement and skill-set of the operating surgeon.


Colorectal—benign
O024—3D modelling in pelvic floor disorders – a literature review
Kelly Chu1, A. Przedlacka1, P. Tekkis1, F. Bello2, C. Kontovounisios1
1Imperial College London, Department of Surgery and Cancer, 2Imperial College London Centre for Engagement and Simulation Science, United Kingdom
Aim: Three-dimensional (3D) modelling technology is becoming increasingly common in use in surgery. It has been utilised to enhance surgical planning, medical education and patient interaction. This literature review aims to explore the current applications of 3D modelling in pelvic floor disorders.
Methods: A comprehensive literature search according to PRISMA protocol was conducted to identify studies describing the use of 3D models in management of pelvic floor disorders between 2000 and 2021. The electronic databases PubMed/Medline, Embase and Ovid were searched. Full-text papers were eligible for inclusion.
Results: 3D models have mainly been applied to the assessment and analysis of pelvic floor anatomy and pelvic floor disorders’ pathophysiology. Other areas of application related to surgical planning, patient education and surgical education. Common disorders where models are employed include peripartum pelvic floor disorders, constipation, incontinence and pelvic organ prolapse (POP). Magnetic resonance imaging was the most commonly used modality for model creation. 3D printed models were less commonly featured in studies than digital 3D models.
Conclusion: The literature search provided insight into the current application of 3D modelling technology in pelvic floor disorders, including the imaging modalities utilized for model creation and the areas of application. It has identified the benefits and limitations of this novel technology and possible directions for further development to enhance the care of patients with pelvic floor disorders.
Colorectal—benign
O025—Functional outcomes following laparoscopic rectopexy for patients with complete rectal prolapse: comprehensive anorectal manometric and scoring assess
Takeyoshi Yumiba, Y. Souma, J. Yasuda, H. Kuno, H. Noshigori, S. Miyazaki, J. Ieda, T. Ono, T. Saito, R. Nezu
Osaka Central Hospital, Department of Surgery Japan
Aims: Overall, laparoscopic rectopexy provides satisfying anatomical correction of complete rectal prolapse. However, its role in restoring anorectal function has yet to be established. The aim of this study was to demonstrate its functional outcomes using high resolution manometry (HRM) and questionnaire-based comprehensive anorectal function assessments.
Methods: Among consecutive 260 patients who underwent laparoscopic rectopexy, 95 patients with full HRM records were retrospectively reviewed. The data included: 1) demographics, types of rectopexy (ventral: LVR or posterior: LPR), and surgical / anatomical results; 2) preoperative and postoperative standard HRM to evaluate changes in functional anal canal length (FACL), maximum resting pressure (MRP), and maximum squeezing pressure (MSP). 3) preoperative and postoperative Fecal Incontinence Severity Index (FISI) and Constipation Scoring System (CSS) to assess changes in severity of incontinence and constipation, respectively.
Results: 1) The median age was 81 years (67–93) with male/female ratio of 12/83. Both LVR (n = 50) and LPR (n = 45) were successfully performed without open conversion. No recurrence was observed in our series. 2) Postoperative HRM was performed in 4 months (median, 3–12 months). FACL did not change significantly before and after surgery in LVR nor LPR patients (42.8 ± 13.4 vs. 40.9 ± 15.8 mm in LVR; 46.6 ± 15.3 vs. 44.0 ± 17.8 mm in LPR, respectively). MRP significantly increased postoperatively in both groups (31.4 ± 19.1 to 38.2 ± 18.9 mmHg in LVR; 27.0 ± 17.8 to 39.8 ± 28.6 mmHg in LPR, p < 0.01). MSP also significantly increased postoperatively in both groups (82.7 ± 55.2 to 95.1 ± 61.3 mmHg in LVR, p < 0.01; 70.8 ± 58.5 to 87.4 ± 63.1 mmHg in LPR, p < 0.05). 3) FISI significantly improved in both groups (33.9 ± 18.7 to 16.1 ± 12.7 in LVR, p < 0.0001; 32.6 ± 17.0 to 21.9 ± 17.5 in LPR, p < 0.01). CSS significantly improved in LVR (6.9 ± 5.9 to 4.6 ± 4.8, p < 0.01), but not in LPR (8.1 ± 4.5 to 6.4 ± 5.4).
Conclusions: Both LVR and LPR are equally effective as anatomical correction procedure, though LVR is considered more preferable than LPR in restoring continence and in improving constipation.
Colorectal—benign
O141—The CRAC study (SICE)—appendectomy at the age of Covid-19 in Italy
Alberto Sartori1, M. Podda2, E. Botteri3, A. Arezzo4, F. Agresta5
1San Valentino Hospital, General and Emergency surgery, 2Azienda Ospedaliero-Universitaria di Cagliari, Policlinico Universitario di Monserrato "Duilio Casula" University of Cagliari, Department of Surgery, 3ASST Spedali Civili di Brescia, Surgery, 4University of Torino, Department of Surgical Sciences, 5Ospedale Civile Vittorio Veneto, Department of General Surgery, Italy
Introduction: The COVID-19 pandemic, with its 58 million cases and 1.3 million deaths across all continents, has radically change hospitals and healthcare systems. A recent study showed that more than 28.000.000 surgical procedures were deleted worldwide over 12 weeks in 2020.
The lifetime risk of acute appendicitis is 6,7% for women and 8,6% for males. The present study aims to evaluate the surgical activity regarding appendectomy in urgency settings on a national basis during the first Italian wave of the COVID-19 pandemic, compared with the same time interval of the previous year.
Materials and Methods: The CRAC study (ChiRurgia Appendiciti Covid-19—Covid-19 Appendicitis Surgery) is a national multicenter, observational study that assesses the outcomes of patients undergoing appendectomy in the two months March–April 2019 (pre-pandemic period) vs. March–April 2020 (pandemic period). One hundred fifty-eight operating units gave their consent to the study's participation, of which 113 (87%) sent the requested data.
The primary outcome measure was the number of appendectomies performed during each of the two-month periods. The appendicitis grade was classified according to the American Association for the Surgery of Trauma (AAST) score. Secondary outcomes were the surgical technique for appendectomy (open vs. laparoscopic), the number of complications classified according to the Dindo-Clavien grading system, and the mortality at 30 days follow-up.
Results: The database included 1541 patients, of which 1337 (86.8%) adhering to the study inclusion criteria. Of these, 546 (40.8%) underwent surgery in 2020 and 791 (59.8%) in 2019 (31% reduction rate). The median age of the patients operated in 2019 was 37 years (19–93) vs 39 years (18–96) of those operated in 2020 (p = 0.526). Surgery was delayed > 24 h after admission for 146 (18.5%) patients in 2019 vs 83 (18.5%) in 2020 (p = 0.122). An open technique was used in 77 (9.7%) patients in 2019 vs 54 (9.9%) in 2020 (p = 0.926). Conversion to open occurred in 31 (3.9%) patients in 2019 vs 31 (5.7%) in 2020 (p = 0.147). Complicated appendicitis was reported in 76 patients (9.6%) in 2019 vs 87 patients (15.9%) in 2020 (p = 0.001). Considering the timing of surgery, 37/229 (16.4%) patients undergoing surgery > 24 h after admission experienced complications compared to 126/1108 (11.4%) patients operated within 24 h (p = 0.046).Data are summarized in Tables 1 and 2.
Table 1.
Main patients’ characteristics, whole cohort stratified by year of surgery
| Risk factors | Pts operated during 2019 (791) | Pts operated during 2020 (546) | p |
|---|---|---|---|
| Age (yrs) | 37(18–96) | 39 (18–93) | 0.526 |
| Gender (M) (# pts) | 435 (55.0%) | 339 (62.1%) | 0.011 |
| Complications (# pts) | 76 (9.6%) | 87 (15.9%) | 0.001 |
| AIR score (# pts with 0–12) | 0.036 | ||
| 1–4 | 193 (24.1%) | 111 (20.3%) | |
| 5–8 | 498 (62.9%) | 333 (60.9%) | |
| 9–12 | 100 (12.6%) | 102 (18.6%) | |
| AAST score (# pts with 1–2-3–4-5) | 0.008 | ||
| 1 | 379 (47.9%) | 223 (40.8%) | |
| 2 | 172 (21.7%) | 105 (19.2%) | |
| 3 | 82 (10.4%) | 69 (12.6%) | |
| 4 | 115 (14.5%) | 112 (20.5%) | |
| 5 | 43 (5.4%) | 37 (6.8%) | |
| Surgery timing (> 24 h) (# pts) | 146 (18.5%) | 83 (15.2%) | 0.122 |
| Surgical approach (open) (# pts) | 77 (9.7%) | 54 (9.9%) | 0.926 |
| Conversion to open (yes) (# pts) | 31 (3.9%) | 31 (5.7%) | 0.147 |
| Atb proph/therapy (short-long-ther) (# pts) | 0.247 | ||
| Short course | 97 (12.3%) | 61 (11.2%) | |
| Medium course | 306 (38.7%) | 192 (35.2%) | |
| Long course | 387 (49.0%) | 293 (53.6%) | |
| Dindo score (# pts with 0–1-2–3-4–5) (# pts) | < 0.001 | ||
| 0 | 2 (0.3%) | 2 (0.4%) | |
| 1 | 664 (84.1%) | 402 (73.8%) | |
| 2 | 95 (12.0%) | 108 (19.8%) | |
| 3 | 19 (2.4%) | 29 (5.3%) | |
| 4 | 8 (1.0%) | 3 (0.6%) | |
| 5 | 2 (0.3%) | 1 (0.2%) | |
| Hospital stay (days) | 3 (1–54) | 3 (1–64) | 0.722 |
Table 2.
Univariate and multivariate logistic regression models (outcome: complications)
| Risk factors | Univariate models | Multivariate model | ||||
|---|---|---|---|---|---|---|
| OR | 95% CI | P | OR | 95% CI | P | |
| Age | 1.02 | (1.01–1.03) | < 0.001 | 1.01 | (0.99–1.02) | 0.123 |
| Gender (M vs F) | 1.55 | (1.10–2.19) | 0.013 | 1.23 | (0.85–1.77) | 0.266 |
| Surgery year (2020 vs 2019) | 1.78 | (1.28–2.47) | < 0.001 | 1.67 | (1.18–2.35) | 0.004 |
| AIR | 1.19 | (1.10–1.28) | < 0.001 | 1.09 | (1.01–1.19) | 0.028 |
| AAST | 1.49 | (1.33–1.68) | < 0.001 | 1.26 | (1.19–1.44) | 0.001 |
| Surgery timing (> 24 vs ≤ 24 h) | 1.50 | (1.01–2.23) | 0.046 | 1.58 | (1.03–2.42) | 0.041 |
| Surgical approach (open vs lap) | 2.71 | (1.75–4.20) | < 0.001 | 2.12 | (1.32–3.40) | 0.003 |
| Conversion to open (yes vs no) | 3.46 | (1.96–6.11) | < 0.001 | 2.66 | (1.12–3.78) | 0.024 |
Discussion: The appendectomy rate for acute appendicitis has drastically dropped during the COVID-19 pandemic, and patients undergoing surgery in March–April 2019 were more frequently affected by more severe forms of appendicitis compared to the same timeframe in 2019.
The reduction in the overall number of appendectomies performed may have several explanations. Patients with right iliac fossa pain may have renounced to seek medical attention in 2020 due to the fear of COVID-19 contagion. Simultaneously, we cannot exclude that surgeons restricted the indications for surgery to more severe cases, offering patients with the mild clinical presentation the opportunity to conservative medical therapy at home. Our study's strength lies in the fact that we demonstrated, through the analysis of individual patients' data, that during the lock-down due to the COVID-19 pandemic, fewer patients sought medical attention for acute appendicitis in Italy. In this context, the rate of complicated appendicitis increased, leading to a relatively higher incidence of postoperative complications than in the past.
Colorectal—benign
O143—Oral neomicin and bacitracin are effective in preventing surgical site infections in elective colorectal surgery: a multicentre randomised trial
Edoardo Forcignano' 1, A. Arezzo1, P. Salusso1, M. Mistrangelo1, N. Vettoretto2, E. Botteri2, N. Cillara3, R Ottonello3, M.A. Bonino1, V. Testa1, FG De Rosa1, S. Corcione1, R. Passera1, M. Morino1
1Città della Salute e della Scienza, Department of Surgical Sciences, University of Torino, 2Ospedale Montichiari- Brescia, General Surgery, 3Santissima Trinità Hospital—Cagliari, Department of General Surgery, Italy
Aim: Several regimens of oral and intravenous antibiotics (OIVA) have been proposed with contradicting results and the role of mechanical bowel preparation (MBP) is still controversial. The aim of this study is to assess the effectiveness of oral antibiotic prophylaxis in preventing Surgical Site Infections (SSI) in colorectal surgery.
Methods: In a multicentre trial we randomized patients undergoing elective colorectal resection surgery, comparing the effectiveness of OIVA versus intravenous antibiotics (IVA) regimens to prevent SSI as primary outcome (NCT04438655). In addition to intravenous Amoxycillin/Clavulanic patients in the OIVA group received Oral Neomicine and Bacitracine 24 h before surgery. MBP was administered only for anterior resections with sub-peritoneal anastomosis.
Results: The trial was stopped during the COVID-19 pandemic, as many centres failed to participate as well as the pandemic changed the rules for engaging patients. Two-hundred and four patients were enrolled (100 in the OIVA and 104 in the IVA group); 3 SSIs (3.4%) were registered in the OIVA and 14 (14.4%) in the IVA group (p = 0.010). No difference was observed in terms of anastomotic leak. Multivariate analysis indicated that OIVA reduced the rate of SSI (OR 0.21 / 95% CI 0.06–0.78 / p = 0.019) while BMI is a risk factor of SSI (OR 1.15 / 95%CI 1.01–1.30 p = 0.039). Subgroup analysis indicated that 0/22 patients who underwent OIVA/MBP + vs. 13/77 IVA/MBP- experienced an SSI (p = 0.037).
Conclusions: Oral Neomicine/Bacitracine and intravenous beta-lactam/beta-lactamases inhibitors reduce SSIa after colorectal resections although not affecting the anastomotic leak in this trial. The role of MBP requires more investigation.
COLORECTAL—Benign
O145—Prognostic factors for an early discharge after emergency laparoscopic appendectomy
Ariel Ezra Chami, Reut Harel, I. Sitton, A. Bitterman
Carmel medical center, Surgery A, Israel
Background: Laparoscopic appendectomy is considered the gold standard treatment for acute appendicitis. Most elective laparoscopic procedures use early discharge protocols, those are not found in emergent laparoscopic appendectomy. This study aimed to determine predictive factors for an early discharge after emergency laparoscopic appendectomy.
Methods: A retrospective case-controlled study conducted at Lady Davis Carmel Medical Center, Israel reviewed patients who underwent an emergency laparoscopic appendectomy between 2016 and 2020. The study compared demographical & clinical characteristics of patients discharged within 24 h (ED group) with those required a longer hospital stay (LD group) to identify predictive factors for an early discharge.
Results: The study included 419 patients, 33% of patients were discharged within 24 h after surgery. Patients in the ED group (34.85 ± 13.31) were younger than patients in the LD group (41 ± 18.39) (t(417) = 3.5288, P < 0.001). Patients who had symptoms for less than a day were more likely to be early discharged (X2(1, N = 419) = 6.618, P < 0.05). The Leucocytes levels in the ED group (11.75 ± 3.90) were lower than levels in the LD group (12.74 ± 4.25) (t(417) = 2.30, P < 0.05). The operative time of patients in the LD group (Mdn = 37) was longer than the time in the ED group (Mdn = 31). Patients who had gangrenous appendicitis were less likely to be early discharged U(LD = 140, NLD = 279) = 14,494, z = 4.3, P < 0.05.
Conclusions: Thinking about early discharge we should take into consideration the following factors: age, duration of symptoms, leucocytes levels, operative time, and surgical findings. Past medical history did not affect the length of stay. An early discharge, in our study, did not increase the complications rate. A prospective study based on these results is the next step in determining if and which patients could be early discharged after an emergent laparoscopic appendectomy.
Colorectal—malignant
O007—Bowel function recovery after laparoscopic transverse colectomy within an ERAS program: a comparison to right and left colectomy
Raffaello Roesel, Lorenzo Bernardi, F. Mongelli, C. Ajani, F. Iaquinandi, D. Celio, D. Christoforidis
Regional Hospital of Lugano, Visceral Surgery, Switzerland
Background: It is known that functional recovery of the bowel is slower after right colectomy (RC) compared to left colectomy (LC), but very little has been reported on transverse colectomy (TC).
Objectives: The aim of this study was to compare the clinical and early functional outcomes of TC, a more infrequent operation, to RC, and LC for colorectal cancer.
Methods: Between December 2011 and December 2017, all patients undergoing elective colon resection in our institution were treated according to a standardized ERAS protocol and entered in a prospective database. We included in the study patients undergoing laparoscopic TC, RC or LC for cancer with curative intent. The primary endpoint was Prolonged Post-Operative Ileus (PPOI), defined as need to insert a naso-gastric tube, or refractory nausea VAS > 4 on or after the third postoperative day. Secondary endpoints were post-operative morbidity and length of hospital stay (LoS).
Results: Out of 286 patients, 126 met the inclusion criteria: 20 underwent TC, 65 RC and 41 LC. Patients in LC group were younger than in TC and RC groups, other baseline demographics were similar. PPOI was observed in 5 (25%), 26 (40%) and 10 (24%) patients in TC, RC and LC groups respectively (p = 0.417). In single group comparisons, the incidence of PPOI in the TC group was significantly lower in comparison to the RC group (OR for RC: 4.255, 95% CI 1.092—16.667, p = 0.037) and similar to the LC group. No significant differences in terms of postoperative complications or LoS stay were observed.
Conclusion: The incidence of PPOI after segmental laparoscopic colectomy for cancer within an ERAS program appears as infrequent in TC as in LC and lower than after RC. It may be reasonable to consider a slower oral intake after RC, as it represents an independent predictor of PPOI.
Colorectal—malignant
O009—Efficacy and safety of fluoroscopy-guided stenting as a bridge to surgery in obstructing colon cancer
Ernesto Barzola1, E. Alvarez2, J. Farre1, P. Bretxa1, J. Guirola2, M.A. De Gregorio2
1Hospital Quirón Torrevieja, General Surgery, 2H.Lozano Blesa Interventional Radiology, Spain
Background: Self-expandable metal stents for treatment of obstructing colorectal cancer have been reported since more than 20 years ago. Although colon stenting is widely accepted in palliation, its role in a curative setting remains controversial. This study aims to describe long-term survival data in a large patient group treated with colon stenting as a bridge to surgery for CRC (colorectal cancer) Methods: This prospective study includes patients with obstructing CRC admitted to Spanish hospital between 2009 and 2020. All patients underwent fluoroscopy-guided colon stenting as a bridge to surgery. Procedure-related adverse events and long-term follow-up data have been collected.
Results: The group included 73(65%) male patients. The average follow-up period was 60 months. In total, 107 patients had colorectal carcinoma and were treated with stenting as a bridge to surgery. Technical and clinical success rates of stenting were 94% and 83%, respectively. Overall survival in this observational cohort was 95%, 72% 48% (1-year, 3-year, and 5-year survival), respectively. Adverse events (AEs) were reported in 18% cases. Severe AEs included perforation 6 (5.4%) and stent migration (5,4%). Multivariable regression has shown that stage (p < ;0,001),male gender (p < ;0,054) and anastomosis completeness (p < ;0,016) were associated with better survival rates. The main limitation of this study was a single-center involvement.
Conclusions: Colon stenting before surgery with a curative intent in patients with obstructing CRC is an effective approach with acceptable survival outcomes affirming the role of stenting as a bridge treatment option.
Colorectal—malignant
O076—TaTME: analysis of the evacuatory outcomes and EUS anal sphincter
Maria Sousa1, A. Goulart2, A.C. Caetano1, A. Parvaiz3, N. Figueiredo3, P. Leão2
1Hospital Braga, General Surgery, 2Hospital Trofa Saude, General Surgery, 3Champalimaud Foundation, Colorectal Surgery, Portugal
Introduction: Some patients undergoing transanal total mesorectal excision (TaTME) may experience post-surgical complications, such as impaired bowel function and urogenital and sexual dysfunction. The present work aims to evaluate the one-year impact of TaTME surgery on bowel function, quality of life, and outcomes.
Material and methods: Twenty patients undergoing TaTME with cancer in the mid and lower rectum were assessed prospectively by endoscopic transanal ultrasound (EUS) and three physiological function degrees, along with different clinical outcome questionnaires.
Results: EUS sphincter evaluation revealed no structural impact in follow-up. For evacuatory evaluation, differences in the scores of the first postoperative month of Wexner questionnaires were shown when compared to a 12-month period. At least 10% of patients remain with major low anterior resection syndrome (LARS) after one year. The (Fecal incontinence Quality of Life) FiQoL questionnaire revealed that the cases in which values were worse in the first month posteriorly recovered to baseline preoperative values.
Conclusions: TaTME does not seem to impact sphincter structure and evacuatory function, with a good recovery rate one year post-surgery, but does not seem to interfere with patients' evacuatory function quality of life.
COLORECTAL—Malignant
O100—Single-stapled anastomosis is associated with less anastomotic failures than double-stapled anastomosis after rectal resection
Caterina Foppa, F. Carrano, M. Carvello, A. Spinelli
Humanitas Clinical and Research Center—IRCCS, Division of Colon and Rectal Surgery, Italy
Aim: The aim of this study was to compare the rates of anastomotic failure (AF) in colorectal single stapled (SS) and double stapled (DS) anastomoses after laparoscopic total mesorectal excision (TME) for rectal cancer.
Methods: Patients undergoing laparoscopic or transanal TME with low colorectal anastomosis (≤ 5 cm from the anal verge), between January, 1st 2010 and August, 31st 2020, were selected from a prospectively collected institutional database and divided in two groups: SS and DS. In the definition of AF we included: early (within 30 days after surgery) and late anastomotic leak, pelvic abscess, anastomotic fistula, chronic sinus, stricture. AFs were classified according to the “International Study Group of Rectal Cancer” definition and severity grading system.
Results: Of 1020 oncological restorative procedures performed in the study period, 550 patients were selected (147 SS and 403 DS). Demographics (including gender, age, BMI, smoking, and comorbidities) were comparable among groups. Patients with a previous history of abdominal surgery and those with severe systemic disease (American Society of Anesthesiology class 3) (p = 0.039) were more frequent in the DS group (p = 0.032).
Distance of the tumor from the anal verge was significantly lower in the SS group (6.3 ± 2.73 vs 8.26 ± 3.56 p < 0.0001), and more patients in the same SS group received neoadjuvant chemoradiotherapy (64.6% vs 49.8%, p = 0.002). Operative time was longer in the SS group (p = 0.040), whereas hospital stay was shorter (p = 0.016). No differences in postoperative transfusions were observed. Thirty-days complication rate was higher in the DS group (32.2% vs 19%; p = 0.016), with comparable Clavien-Dindo grades (p = 0.789). No differences in 90-days complications were recorded among groups. AF rate was significantly lower in the SS group (6.1% vs 18.1%; p = 0.0004), with equal rate of early AF (p = 0.911). No anastomotic strictures were observed in the SS group while 13.7% in the DS. At logistic regression analysis DS anastomosis (p < 0.0001) and smoke habit (p = 0.049) resulted independently associated with AF.
Conclusions: After laparoscopic TME for rectal cancer, SS anastomosis was associated with a lower rate of AF.
Colorectal—malignant
O102—Fashioning enterotomy closure after totally laparoscopic ileocolic anastomosis for right colon cancer: a multicenter experience
Michele Manigrasso1, S. Vertaldi2, G.D. De Palma2, M. Milone2
"Federico II" University of Naples, 1Department of Advanced Biomedical Sciences, 2Department of Clinical Medicine and Surgery, Italy
Aims: Laparoscopic right hemicolectomy is a commonly performed procedure. Little is known on how to perform the enterotomy closure after stapled side-to-side intracorporeal anastomosis. To analyze the advantages and disadvantages of double layer versus single layer, sewn versus stapled and robotic versus laparoscopic approach, in a representative study population, we designed a multi-institutional audit.
Method: A multicentric case-controlled study has been designed to compare different ways to fashion enterotomy closure: double layer versus single layer, sewn versus stapled, and robotic versus laparoscopic approach. Furthermore, additional characteristics including sutures' materials, interrupted versus running suture and the presence of deep corner suture has been investigated.
Results: We collected data for 1092 patients who underwent right hemicolectomy at ten centers. We analyzed 176 robotic against 916 laparoscopic anastomosis: no significant differences were found in terms of bleedings (p = 0.455) and anastomotic leak (p = 0.405). We collected data from 126 laparoscopic sewn single-layer versus 641 laparoscopic sewn double-layer anastomosis: a significant reduction was recorded in terms of leaks in double-layer group (p = 0.02). About double-layer characteristics, we found a significant reduction of bleedings (p = 0.008) and leaks (p = 0.017) with a running suture; similarly, a reduction of bleedings (p = 0.001) and leaks (p = 0.005) was observed with the usage of deep corner closure. The presence of a barbed suture thread seemed to significantly reduce both bleedings (p = 0.001) and leaks (p = 0.001). We found no significant differences in terms of bleedings (p = 0.245) and anastomotic leak (p = 0.660) comparing sewn versus stapled anastomosis.
Conclusions: Fashioning a stapled ileocolic intracorporeal anastomosis, we can recommend the adoption of a double-layer enterotomy closure using a running barbed suture in the first layer. Totally, stapled closure and robotic assistance have to be considered a non-inferior alternative.
Colorectal—malignant
O115—Benefits of Rica in colorectal surgery in a regional hospital
Clara Arrieta Martinez, I.M. Muñoz Nuñez, J. Pereira Grillo, P. Vazquez Barros
H. Santa Ana, General Surgery, Spain
The clinical pathway of Intensified Rehabilitation in Abdominal Surgery (RICA) in its Spanish acronym, is made up of a series of measures applied by a multidisciplinary team that includes multiple medical specialties, the nursing team and the patient. The goal is a reduction of patient’s stress, secondary to the intervention, which allows be recovered in the shortest period of time.
Aims: To analyze the mean hospital stay of patients undergoing scheduled colorectal malignant disease after implantation of the RICA route, since this parameter is considered a quality indicator according to the Spanish Coloproctology Association (AECEP).
To check if there is a decrease in hospital stay after the application of the RICA pathway measures improved by the coordinated action among professionals and the experience in the development of the pathway.
Methods: The beginning of the use of the RICA was in 2018, so the analyzed data have been collected in a period between 01/01/2018 and 12/31/2019 and they have been compared with the information achieved since 1/01/2020 to 12/31/2020.
Results: In the first period of time, taking into consideration patients underwent programmed surgery for colorectal malignant disease (127 patients), the mean stay was 11.28 days. 16.23% correspond to sigmoid surgery patients (31 patients) with a mean stay of 11.97 days. 25.13% were rectal surgery patients (48 patients) with a mean stay of 11.85 days.
On the other hand, in the period since 01/01/2020 to 12/31/2020, 51 patients were treated, of which were 20.45% patients with sigmoid disease (18 patients) and 13.64% were rectal surgery patients (12 patients). The mean global hospital stay is reduced to 6.72 days, while considering sigmoid or rectal surgery, the hospital stay is 6.41 days and 6.50 days respectively, reducing the hospital stay by half compared to the initial period of the implantation of the RICA route.
Conclusion: The upgrade’s results reflects how an improvement in coordination and training of differents health teams in the application of the RICA route, allows to promote the recovery of patients, shortening the average hospital stay and allowing the patient to return home, avoiding complications derived from prolonged hospitalization.
Colorectal—malignant
O118—Does the performance of a multimodal pre-habilitation protocol gives patients with colorectal cancer better quality life after surgery?
Álvaro Soler-Silva, Luis Sánchez-Guillen, D. Triguero, A. Sanchís-López, S. Lario-Pérez, C. Lillo, F. López-Rodríguez Arias, L. Sánchez-Guillén, I. Oller, V. Aranaz, M.J. Alcaide, A. Arroyo
Elche University Hospital, Alicante, Spain, Department of General Surgery, Colorectal Unit., Spain
Objectives: The main objective of this study is to assess the variation in quality of life, using a standardised questionnaire, after a multimodal prehabilitation outpatient protocol (PPMA) in patients undergoing colorectal surgery. The secondary objectives are to assess the physical and mental spheres.
Material and methods: A pilot randomised clinical trial was carried out randomising the performance of a PPMA in 25 patients, 16 control group and 9 prehabilitation group, operated on for colorectal cancer. Quality of life was analysed the month before and 6 weeks after the intervention using the SF-36 (v2.0) and HADS questionnaires. The PPMA consisted of 30–40 min of aerobic exercise/day for 3 weeks, muscular resistance exercises 3 days/week, relaxation exercises and nutritional protein supplementation of 1.2 g/kg/day. A T-Students and Mann Whitney U hypothesis test was performed, considering significant differences p < 0.05, using the SPSS v.25.0 IBM corporation programme.
Results: The comparison between the HADS and Sf-36 test scores of both groups at week 6 post-surgery (Table 1) showed significant differences in the following areas: Mental Health [68.0 (52.0—79.0)] with a p 0.01, Social Function [63.0 (40.6–100.0)] with a p 0.008, and mental component [62.5 (25.7)] with a p 0.03. 01, Social Function [63.0 (40.6–100.0)] with a p 0.008, and Mental Component [62.5 (25.7)] with a p 0.03. In the rest, no significant differences were obtained when comparing the results obtained between the two groups (p > 0.05). Compliance with the PPMA was over 80% in the 9 patients included in the Prehabilitation group.
Conclusions: The PPMA offers an improvement in the quality of life in the spheres of Mental Health and Social Function of post-operative patients, improving the overall mental sphere of the patient.
Colorectal—malignant
O121—Comparison of laparoscopic and transanal approach to total mesorectal excision: an analysis of short and mid-term outcomes
Anna Lasek, M. Pisarska-Adamczyk, K. Kołodziejska, A. Dróżdż, M. Pędziwiatr, M. Rubinkiewicz
Jagiellonian University Medical College, 2nd Department of General Surgery, Poland
Aims: The study is designed to compare short and mid-term results of laparoscopic total mesorectum excision (LaTME) to transanal total mesorectem excision (TaTME).
Methods: Eighty-two patients underwent total mesorectal excision for low rectal cancer between 2013 and 2017 in 2nd Department of General Surgery Jagiellonian University Medical College. 70 of them with known 3-years survival were enrolled to the study.
Results: 40 and 29 patients underwent LaTME and TaTME, respectively. Both groups did not differ in regard to age, sex, comorbidities or neoadjuvant radiotherapy. Perioperative outcomes, including operative time, blood loss and intraoperative adverse events did not differ significantly between groups either. Statistical significant differences in regard to length of hospitalization, complications, readmission, completeness of mesorectal excision, R0 resection rate, number of harvested lymph nodes, circumferential resection margin, and distal resection margin were not found. 3-year survival rate was higher in TaTME group (96,5% vs. 78%, p = 0.029).
Conclusions: This study shows benefits of TaTME technique regarding 3-year survival. However, those results should be reconsidered after 5-year follow-up. Regarding short term results transanal approach is not superior to LaTME. Further evaluation of TaTME comparing to LaTME should consist of large randomized control trials.
Colorectal—malignant
O172—Uncovering topography and extent of injury to the superior mesenteric plexus in right colectomy w/ extended D3 mesenterectomy. A composite 3D analysis
Javier Armando Luzon1, Y .Thorsen1, B.V. Stimec5, L.P. Nogueira4, S.N. Andersen2, H.J.Haugen4, B. Edwin3, D. Ignjatovic1
1University of Oslo/ Akershus University Hospital /Institute of Clinical Medicine, Department of Digestive Surgery, 2University of Oslo/Institute of Clinical medicine/ Akershus University Hospital, Department of Pathology, 3Oslo University Hospital, The Intervention Centre, 4University of Oslo/Institute of Clinical Dentistry, Department of Biomaterials, Norway. 5Faculty of Medicine, Teaching Unit. University of Geneva, Anatomy Sector, Switzerland
Aims: To describe superior mesenteric artery plexus (SMAP) microanatomy and extent of injury after right colectomy with extended D3 mesenterectomy for cancer. SMAP injury is reported to cause postoperative intractable diarrhea after pancreatic/colonic surgery with extended lymphadenectomy.
Methods: Three specimen groups: (I)Anatomical dissection, (II)Postmortem histology; (III)Surgical specimen histology. Nerve count and area were compared between groups II-III and paravascular sheath thickness between groups I-II. 3D-models were generated through nanoCT and 3D-histology.
Results: Total 21 specimens: Group(I): 5(3 females,80-93y), the SMAP is a complex mesh surrounding the superior mesenteric artery (SMA), branching out, following peripheral arteries and intertwining between them (II): 7(5 females,71-86y), nerve count: 53 + 12.42(38–68), area: 1.84 + 0.50mm2(1.16–2.29). (III): 9 (5 females, 55-69y) nerve count: 31.6 + 6.74(range 23–43); area: 0.889 + 0.45mm2(range 0.479- 1.668). SMAP transection injury is 59 and 48% respectively at middle colic artery origin level. The paravascular sheath thickness decreased caudally from 2.05 to 1.04 mm (anatomical dissection), and 2.65 to 1.17 mm (postmortem histology). 3D-histology models present nerve fibers exclusively within the paravascular sheath, lymph nodes were observed only outside. NanoCT reveals an oblique nerve fiber trajectory with an inclination of 35 degrees.
Conclusions: SMAP surrounds the SMA and branches within the paravascular sheath, while bowel lymph nodes and vessels lie outside. Extent of SMAP injury on histological slides (transection only) was 48% nerve area and 59% nerve count. The 35 degree inclination of SMAP nerves possibly implies an even larger injury when plexus excision is performed (lymphadenectomy). Reasons for improvement of bowel function can lie in the inter-arterial nerve fibers between SMA branches.
Colorectal—malignant
O174—Use of indiocianine-green fluorescence for lymphography and accurate lymphadenectomy in robotic right emicolectomy
Gloria Gallotti, Graziano Pernazza, R. Mancini, L. Ioni, T. Picconi, C. Montanari, P. Campagna
AO San Giovanni Addolorata Hospital / Robotic General Surgery Unit, Surgery, Italy
Aim: the aim of this study is to evaluate the effectiveness of indocyanine-green (ICG) intraoperative usage as a guide for an extended and accurate lymphadenectomy in patients with right colon cancer diagnosis treated with right emicolectomy.
Methods: In our study, since January 2020 to March 2021, we recruited 18 consecutive patients with right colon cancer diagnosis subjected to robotic-assisted right emicolectomy. Patients group consisted of 6 males and 12 females, aged between 60 and 93 years old with histological based diagnosis (9 cecum cancers, 3 hepatic flexure cancers, 3 ascending colon cancers, 3 transverse colon cancers). We divided the population in two groups: group A (9 patients) in which we performed standard technique of right emicolectomy with “complete mesocolic excision” (CME) without ICG usage; group B (9 patients) in which we performed right emicolectomy with intraoperative submucosal ICG injection and fluorescence to guide the CME lymphadenectomy. After surgery the number of lymphonodes was analized by definitive hystological examination.
Results: thw average number of lymphonodes collected was 12,33 (from 8 to 15 lymphonodes) in the group A (non-ICG group). In group B (ICG-fluorescence) the average number of lymphonodes was 21,67 (from 15 to 29 lymphonodes). In group A the mean operative time was 205,7 min, in the B group was 206 min. There were ICG-related complications in none of the 9 patients. After the histological examination we found 1 patient in the group A and 2 patients in the group B with metastatic lymphonodes (pN1b-pN2c). All the patients were R0 after surgery.
Conclusions: Our results confirm that intraoperative ICG-fluorescence for lymphography may be useful for identifying and retrieving lymphnodes for a complete lymphadenectomy, leading to a more accurate staging of the disease. Furthermore, in our study the use of this tool did not entail a relevant operating time extension confirming the efficacy for limphadenectomy and its feasibility.
Colorectal—malignant
O175—Better exercise and food, better recovery (BEFORE): feasibility study
Misha Sier, Thaís Tweed, J.H.M.B Stoot, E. Boerma, A. Van Bodegraven, N. Van Nie-Visser
Zuyderland Medical Center, Surgery, The Netherlands
Introduction: Prehabilitation has been postulated as an effective preventive intervention to reduce postoperative complications, particularly for elderly patients with a relatively high risk of postoperative complications. To date it remains to be demonstrated whether prehabilitation increases physical capacity and reduces postoperative complications. The aim of this study was to assess the feasibility of a multimodal prehabilitation program consisting of a personalized, supervised training program and nutritional intervention for colorectal cancer patients aged ≥ 65 years prior to colorectal surgery.
Methods: This single-center study was a prospective feasibility study carried out in one large teaching hospital in the Netherlands. Patients (≥ 65 years) with colorectal (pre)malignancy scheduled for elective colorectal resection were included in the study. The multimodal prehabilitation program consisted of a 4-week supervised in-hospital, personalized exercise program (three sessions a week, twelve in total) and nutritional intervention (three fresh protein-rich meals and three snacks every day). The primary outcome was the feasibility, defined as ≥ 80% compliance with the training program and nutritional intervention. Secondary outcomes were the organizational feasibility and acceptability of the prehabilitation program.
Results: Nine patients were included in the study. A total of seven patients attended ≥ 80% of the 12 intended supervised training sessions; all participants attended ≥ 80% of the available training sessions. Overall, compliance with the training was 91.7%. Compliance of ≥ 80% with the nutritional program was accomplished by 6 patients. The median protein intake was 1.2 g/kg/d. Also, organizational logistics concerning this multimodal prehabilitation program was feasible. After the prehabilitation an improvement was observed in maximum heartrate, muscular strength, exercise capacity, FCV and FEV1. Participants appreciated the multimodal prehabilitation program and considered it to be acceptable. No adverse events related to prehabilitation occurred.
Conclusion: Multimodal prehabilitation with personalized training and nutritional intervention was feasible for the majority of patients in terms of adherence, organization and acceptance. Further studies will be conducted to investigate the merits of this program for colorectal cancer patients.
Colorectal—malignant
O176—The correlation between serum vascular endothelial growth factor (VEGF) and tumor VEGF receptor 3 in colorectal cancer
Maria Sousa1, P. Leão2, A. Goulart2
1Hospital Braga, General Surgery, 2Hospital Trofa Saude, General Surgery, Portugal
Purpose: Despite plasma biomarkers offering a number of advantages over tissue-based markers, the relationship between serum vascular endothelial growth factor (VEGF) and VEGF receptor (VEGF-R) tumor expression in colorectal cancer (CRC) is still unclear. This study was designed to establish the relationship between the concentration of serum VEGF and tumor VEGF-R expression in patients with CRC.
Methods: A prospective study of consecutive patients undergoing elective colorectal surgery during 1 year. Preoperative VEGF was determined by enzyme-linked immunosorbent assay and VEGF-R3 by immunochemistry.
Results: The initial sample included 134 patients with CRC diagnosis. Results showed significant association of serum values of VEGF with VEGF-R3 expression (P < 0.001), even in the presence of confounders (sex, age, body mass index, tumor location, and surgical approach). The estimated effect size was high (η2 = 0.35).
Conclusion: Serum VEGF has a significant correlation with tumoral VEGF-R3 expression in CRC.


Colorectal—malignant
O178—Endoscopic mucosal resection and endoscopic submucosal dissection or transanal endoscopic microsurgery for large rectal adenomas
Mario Guerrieri1, Monica Ortenzi1, E. Forcignanò2, G Pentassuglia2, S. Williams3, A. Emmanuel3, A. Haji3, R. Ghiselli1, A. Arezzo2, M. Morino2
1Polytechnic University of Marche, Department of General and Emergency surgery, 2University of Torino, Department of Surgical Sciences, Italy. 3King's College Hospital NHS Foundation Trust, Department of Colorectal Surgery, United Kingdom
Aims: To compare the safety and effectiveness of endoscopic mucosal resection (EMR), endoscopic submucosal dissection (ESD) and full-thickness rectal wall excision by transanal endoscopic microsurgery (TEM) in the treatment of large non-pedunculated rectal lesions preoperatively assessed as non-invasive.
Methods: We merged the prospective databases of patients who underwent EMR, ESD or TEM between January 2011 and June 2020 and analysed the data retrospectively. Inclusion criteria was the presence of a large non-pedunculated rectal neoplasms located up to 15 cm from the anal verge and preoperatively assessed as non-invasive, either by preoperative biopsies or by the absence of endoscopic signs suspicions for malignancy (e.g. non lifting sign) or T2 infiltration at the pre-operative ultrasound.
The primary endpoint was recurrence rate. Secondary endpoints were intra-operative and post-operative morbidity and the need for abdominal surgery for oncologic reasons. The analysis was conducted according to the intention-to-treat principle.
Results: A total of 1054 patients were included in the analysis, 683 treated by TEM, 125 by EMR, 246 by ESD although 67 received a hybrid technique for technical difficulty. The en-bloc resection rate was 99.7% (95% confidence interval [CI] 93.1.-7) for TEM versus 20% (95% CI 13- 0.3) for EMR (p < 0.0001) and 68.3% (95% CI 0.58–0.79) for ESD (p < 0.0001). The R0 resection rate was 85% (95% CI 80.6 – 94.8) for TEM versus 26.4% (95% CI 0.18–0.37) for EMR (p < 0.001) and 53.1% (95% CI 0.47–0.66) for ESD (p < 0.001). The postoperative complications rate was 6.5% (95% CI 4.8 – 8.8) after TEM versus 0.8% (95% CI 0.02–0.4) after EMR and 2.8% (95% CI 1.14–5.86) after ESD (p < 0.0001).
Thirty-three patients underwent subsequent radical surgery: 18 in the TEM group, 6 in the EMR group and 2 in the ESD group. With a median follow-up of 54 months (IQ 16–91), the recurrence rate was 5.1% (95% CI 3.6 -7.1) for TEM, versus 18.4% (95%CI 11.6 – 27.6) for EMR (p < 0.0001) and 8.9% (95%CI 5.6–13.5) for ESD (p = 0.042). Nevertheless, the overall need for further abdominal treatment rate, including both complications and pathology indications, was 3.6% (95% CI 0.3–2) for TEM versus 9.6% (95% CI 4.9 – 16.7) for EMR (p = 0.001) and 0.8% (95% CI 0.09 – 1.9) for ESD (p = 0.813). (Table 1).
Table 1.
Post procedural definitive histology
| TEM (n = 683) |
EMR (n = 125) |
ESD (n = 246) |
|
|---|---|---|---|
| Adenoma | n = 592 (82.7) | n = 112 (89.6) | n = 220 (84.6) |
| LGD (n%) | 167 (24.4) | 81 (63.2) | 155 (63) |
| HGD (n%) | 425 (62.2) | 31 (24.8) | 65 (26.4) |
| Carcinoma | n = 91 (13.3) | n = 10 (11.2) | n = 25 (10.2) |
| Tis (%) | 12 (1.7) | 2 (1.6) | |
| T1 (%) | 56 (8.2) | 8 (6.4) | 21 (7.8) |
| T2 (%) | 23 (3.4) | 4 (2.6) | |
| Not retrieved | 3 (2.4) | 1 (0.4) |
Conclusions: Recurrence rate was significantly lower in the TEM group. This may be the consequence of a higher R0 resection rate when performed full-thickness.
Colorectal—malignant
O179—A systematic review and network meta-analysis of vessel sealing devices in laparoscopic colorectal surgery
Christos Athanasiou, A. El Hadi, J. Hernon, A. Stearns
Norfolk and Norwich University Hospital, Upper GI, United Kingdom
Aim: To systematically review the available literature and if appropriate perform a multi treatment comparison meta-analysis to assess the comparative efficacy of available vessel sealing devices (VSD).
Methods: Medline, Embase, Cochrane library and Scopus were searched for randomized controlled trials (RCTs) comparing VSD in laparoscopic colorectal surgery. Data were extracted to tables and quality assessment of the studies performed using the Jadad score. Primary outcome of the study was operative time and secondary outcomes included blood loss, complications, conversion to open or other instruments and length of stay. Network meta-analysis was performed to pool direct and indirect evidence. The shape of the network plot was examined for each outcome. All VSD were ranked using the surface under the cumulative ranking curve value and a probability > 90% was required to report the best device. The Grade guidelines were used to quality assess the outcomes of interest.
Results: Eight RCTs fulfilled the inclusion criteria. VSD included electrosurgery (ES), bipolar vessel sealers (BVS), ultrasonic shears (US), a hybrid device combining ultrasonic and bipolar energy (BUVS) and clips or staplers (C/S). Direct comparisons comprised of BUVS vs US (1 RCT, 44 patients), BVS vs ES (2 RCTs, 57 patients), US vs ES (3 RCTs, 194 patients), BVS vs US (3 RCTs, 208 patients), 5 mm vs 10 mm BVS (1 RCT, 30 patients) and BVS vs C/S (2 RCTs, 200 patients). The pairwise meta-analysis of US vs ES showed decreased blood loss (WMD = -43.66 [-63.52, -23.81]; P < 0.0001) and decreased conversion to other instruments (OR = 0.19 [0.07, 0.51]; P = 0.001) in favor of US. Considering the inconsistency between studies none of the energy sources had an impact on operative time in network meta-analysis. US as compared to ES kept its statistical significance in network meta-analysis with decreased blood loss (WMD = -42.66 [-61.76, -23.47]. No difference between VSD was found in length of stay, conversion, or complications. None of the VSD reached the prerequisite probability to be ranked first in any of the above outcomes.
Conclusion: The number of published RCT still remains low and no clear benefits were demonstrated between VSD.
Colorectal—malignant
O180—Is triggering receptor expressed on myeloid cells 1 (TREM-1) protein a new marker of serious infectious complications in colorectal surgery?
Magdalena Pisarska-Adamczyk, A. Rzepa1, M. Kapusta2, B. Kuśnierz-Cabala2, M. Wysocki1, P. Małczak1, P. Major1, M. Wierdak1, M. Pędziwiatr1
Jagiellonian University Medical College, 12nd Department of General Surgery, 2Department of Diagnostics, Chair of Clinical Biochemistry, Poland
Aim: The aim of the study was to assess the usefulness of the Triggering Receptor Expressed On Myeloid Cells 1 (TREM-1) protein as a marker of serious infectious complications in laparoscopic colorectal surgery.
Methods: 68 patients with colon or rectal cancer, who underwent elective laparoscopic colorectal cancer surgery between November 2018 and February 2020 were included into analysis. Blood samples for the TREM-1 protein assay were collected from each patient four times: preoperatively and on three following postoperative days (PODs). Patients were divided into two groups depending on the presence of infectious complications. Consecutive patients with infectious complications were included in the Group 1 (32 patients). Group 2 comprised of consecutive patients without complications (36 patients). Serious complications occurred in 13 patients (Clavien-Dindo Classification 3–5).
Results: There were no statistical differences between the groups based on demographic and operative parameters. Median length of hospital stay was statistically longer in Group 1 as compared with Group 2, 11 vs 5 days (p < 0.001), respectively. Preoperative measurements of TREM-1 protein did not differ between groups. There were no significant differences in measurements between those groups on first and third postoperative day. Median TREM-1 measurement was significantly higher in the Group 1 on the second postoperative day (542 vs. 399 pg/ml; p = 0.040), respectively. The difference was more noticeable when only severe postoperative complications were taken into consideration. Median TREM-1 level was significantly higher in group with severe infectious complication when compared to the group without any complications in POD 1 (p = 0.006), 2 (p = 0.002) and 3 (p = 0.003). The receiver operating characteristic (ROC) curve showed that TREM-1 measurements in 2 POD had sensitivity of 83% and specificity of 84% (AUC 0.8, 95%CI 0.65–0.96) and in 3 POD sensitivity of 80% and specificity of 85% (AUC 0.84, 95%CI 0.66–0.99) for the occurrence of severe infectious complications. Most importantly, the sensitivity resulted 90% in 1 POD, with specificity of 70% (AUC 0.78, 95%CI 0.64–0.92).
Conclusion: TREM-1 measurements could become a useful predictive marker in the early detection of severe infectious complications in patients undergoing laparoscopic colorectal surgery.
Colorectal—malignant
O181—Endoluminal negative pressure therapy in colorectal anastomotic leaks—11 years experience
Mateusz Wierdak1, M. Tusinski2, K. Kolodziejska1, J. Strojek1, A. Sorowka1, P. Major1, M. Mizera1, M. Pedziwiatr1
Aims: To present 10 years of experience in treatment of rectal anastomotic leaks with the endo-sponge therapy, and to evaluate the efficiency of novel technique of endo-sponge therapy combined with lavage.
Methods: Consecutive patients diagnosed with colon or rectal anastomotic leakage, managed with endo-sponge placement between January 2010 and December 2020 were enrolled. Next 3 groups of patient were distinguished. First group (I) treated from January 2010 until November 2014—where standard endo-sponge technique was used. Second (II) treated from December 2014 until January 2017, where novel lavage technique was added. Third group (III) treated from February 2017 until now in which lavage technique were used fallowed by early endoluminal suturing of anastomotic leak.
Results: 31 patients were enrolled, including 16 (51,6%) with diverting ileostomy. Following endo-sponge applications (median sessions: 9, range: 1–20; median treatment duration: 4 weeks, range: 1–15), a complete healing was achieved in 28 (90,3%) patients. Only minor complications were observed in 5 patients. Ileostomy closure was achieved in 14 (87.5%) patients. No mortality related to the procedure was observed. Comparison of the three groups revealed a significant reduction of complete leak treatment time observed in groups with lavage [I—32 days (25—103); II- 22 days (18—40) p < 0.05] and in group III [I—32 days (25—103); III- 17 days (14—32) p < 0.05].
Conclusions: Our relatively large series of patients confirmed the efficacy, of endo-sponge therapy for colorectal anastomosis leakage treatment. Usage of lavage technique followed with early endoluminal suturing of anastomotic leak significantly reduce time of treatment with this technique.
Colorectal—malignant
O209—Rate of local recurrence in a cohort of 125 patients treated by transanal total mesorectal excision due to rectal cancer
Gioia Pozza, S. Gloor, R. Troller, M. Adamina
Cantonal Hospital Winterthur, Department of Visceral and Thoracic Surgery, Switzerland
Background: Transanal total mesorectal excision (taTME) is an alternative to conventional TME owing to its reported superior ability to achieve clear resection margins in low rectal cancers. Yet, nationwide Norwegian data claimed a 12-month local recurrence rate of up to 10%, a three-fold increase compared to conventional TME, questioning the oncological safety of taTME.
Methods: Consecutive patients with low rectal cancer treated by taTME were prospectively included. Patients who required a partial mesorectal excision were excluded. Perioperative outcomes were reported as median & interquartile range (IQR). Data were independently audited and certified.
Results: 125 patients (88 men: 37 women) with a low rectal cancer (7 cm to anal verge, IQR 5–9) underwent a taTME. Age and body mass index were 65 years (IQR 56–76) and 26 kg/m2 (IQR 23–29). 87 (70%) patients had neoadjuvant radiochemotherapy. Surgery time was 357 min (IQR 303–435), including an ileostomy in all patients. 1 patient (0.8%) required a conversion to laparotomy. Performing taTME in a 2-team technique saved 94 min or 19% operating time (p < 0.005, t-test one-team (n = 52, 420 min, IQR 349–494) vs. 2-team (n = 73, 326 min, IQR 285–372). 30-day morbidity amounted to 36% minor complications (Dindo Clavien I-II) and 25% major complications (Dindo Clavien III-V), including 11 anastomotic leaks (9%) and 3 reoperations (3%). Most of the leaks could be managed endoscopically and the ileostomy reversed at last. Median length of hospital stay was 10 days (IQR 8–14).
Median follow-up was 45 months (IQR 25–67; range 13–95). Dissection of the mesorectum was excellent (Quirke 1 incomplete mesorectal excision rate: 1.6%) with 100% clear margins (distal margin 16 mm, IQR 10–30; circumferential margin 10 mm, IQR 5–15). Median T stage was 3 (IQR 2–3). 24 patients had positive lymphnodes (median 27, IQR 21–38). Local recurrence occurred in 7 (6%) patients and development of metachronous metastasis occurred in 36 (29%) patients. This led to a 5-year disease-free survival of 56% and a 5-year overall survival of 86%.
Conclusion: Transanal total mesorectal excision allows good surgical and oncologic quality to the expenses of a reasonable surgery time and morbidity.
Colorectal—malignant
O210—3D virtual reconstruction of anatomy for surgical planning in rectal cancer
Madalin Moraru1, Silviu Daniel Preda2, S. Patrascu2, G. Gruionu3, L.G. Gruionu3, S. Maces1, S. Ramboiu2, D Margaritescu2, A .Goganau2, D. Dumitrescu1, M.V. Surlin2
Craiova Emergency Clinical Hospital, 1Department of Radiology, 2First Clinic of Surgery, 3University of Craiova, Faculty of Mechanics, Romania
Background: This is a pilot study aiming to assess a new software solution that allows the surgeon to preoperatively plan a laparoscopic procedure in the field of rectal surgery.
Method: We devised an integrated surgical planning computer program that allows for both 3D reconstruction of computed tomography images and simulation of the anatomical working space in minimally invasive surgery. Preoperative planning is facilitated by the possibility of positioning and manipulation of various laparoscopic instruments in a 3D reconstruction surgical space at different working angles and topographic coordinates.
Results: The software successfully recreated the tridimensional virtual models based on the contrast-enhanced computed tomography images of four patients undergoing laparoscopic rectal cancer surgery. Our software program allowed the operator to virtually test and change the location of the working trocars, as well as to provide a specific set of coordinates for trocar positioning, based on the values of the manipulation, elevation, and azimuth angle.
Conclusion: The 3D simulation software is a safe and efficient instrument for tridimensional virtual reconstruction and surgical planning, allowing us to further test it in the clinical setting. Due to empiric trochar placement in laparoscopic rectal surgery, we believe that preoperative planning of trochar placement may lead to an increase in surgeon ergonomy and a decrease in operative time and blood loss.
Colorectal—malignant
O211—Transanal endoscopic microsurgery after endoscpic polypectomy
Vasil Sotirov Kyosev1, P. Ivanov2, V. Mutafchiyski2, G. Kotashev2, K. Vasilev2, G. Grigorov2, D. Penchev2, M. Gavrilov2
Military Medical Academy, 1Endoscopic surgery, 2Clinic of Endoscopic,Endocrine surgery and Coloproctology, Bulgaria
Aims: Management of malignant rectal polyps (MRPs) after endoscopic polypectomy (EP) is still debated. It is sometimes difficult to decide whether to simply follow- up (FU) or to treat such a removed lesion. Transanal endoscopic microsurgery (TEM) could have a role both in T staging and in treating MRPs after EP. This announcement presents our experience in this topic.
Methods: From January 2015 until March 2017 in our unit thirteen consecutive patients with MRPs underwent a full-thickness TEM within 1 month after EP. These patients were retrospectively analyzed. If post-TEM histology showed locally advanced rectal cancer, patients underwent a laparoscopic total mesorectal excision (TME) within 4–6 weeks. Patients without malignant disease or pT1sm1 cancers at post-TEM histology were followed up every 3 months for 2 years with clinical examination, flexible rectal endoscopy, and neoplastic markers monitoring.
Results: A total of 13 patients were included. Post-EP histology was adenocarcinoma in 9 cases (69.2%) and adenoma in four (30.8%). Mean operative time was 74.2 min; no 30-day mortality occurred; 30-day morbidity was 7.7% (rectal bleeding in one case). Post-TEM histology showed a T2 cancer in two patients (15.4%), both with a previous cancer diagnosis, who were further treated by laparoscopic TME and are disease free with a mean FU of 22.2 months. Post-TEM histology showed adenoma in 4 cases and fibrosis in 7 patients. These patients are disease free with a mean FU of 18 months.
Conclusions: A full-thickness TEM after EP of MRPs can establish the presence of residual malignant disease and its depth of invasion, precisely defining the indication to TME. In event of benign post-EP histology, TEM must be performed in presence of macroscopic residual disease, in order to obtain an RO resection and finally exclude cancer, while, in absence of macroscopic residual disease, only close FU is required.
Keywords: transanal endoscopic microsurgery, rectal polypus, endoscopic polypectomy.
Colorectal—malignant
O212—Efficiency of the robotic platform in sphincter preservation in patients with Mid/Low rectal cancer
Thalia Petropoulou1, P. Kitsanta2, S. Amin3
1Aretaieio University Hospital, Euroclinic Athens, Colorectal Surgery, Greece. 2Sheffield Teaching Hospitals, pathology, 3colorectal surgery, United Kingdom
Aims: The aim of this study is to investigate whether the robotic platform can have a positive impact in sphincter preservation in patients with low rectal tumours, undergoing robotic TME, in comparison with laparoscopic or open TME.
We also analyzed and compared short term outcomes.
Methods: A prospectively collected robotic database was reviewed and compared with the trust data. This includes all rectal resections which were performed with the robotic platform, over a period of 5 years, versus the trust data for the same period.
Results: 311 patients were analyzed.
The 3 groups were robotic versus open versus laparoscopic approach.
Only patients with tumours less than 10 cm from anal verge were included.
Demographics for the 3 groups (sex, age, BMI) were similar.
The percentage of APER (abdominoperineal resection) rate was significant less in the robotic group (15,6% vs 41,4% vs 54,5, p < 0.001).
Median LoS, complication rate, CRM (+) rate for the robotic group was also statistically significant lower in all subgroup analyses. Specimen quality (TME grade, depth of mesocolon, LN harvested) was better for the robotic group.
Conclusion: Robotic surgery for rectal cancer is safe and feasible, and could help surgeons perform ultra low rectal resections, rather than APER’s and save patients sphincters. CRM (+) rate is low, which could lead to improved oncological outcomes.
Colorectal—malignant
O213—Setting up a specialized robotic colorectal center for ‘’high risk’’ patients in Greece; our preliminary results
Thalia Petropoulou1, A Polydorou2
Aretaieio University Hospital, Euroclinic Athens, 1Colorectal Surgery, 2General Surgery, Greece
Aims: When it comes to colorectal surgery for cancer, and especially in ‘’high risk’’ patients, it is widely accepted now that specialized surgeons and high-volume centers could result in better oncological outcomes.
However, in many European countries (Greece included), sub-specialization is not mandatory and there are still ‘’general ‘’ surgeons, performing most resections, including these for cancer; this could lead to impairment of oncological results, as well as bad short-term outcomes too.
We aim to present our experience, setting up a specialized colorectal center in Greece.
Methods: Our program started in end of 2019. We use a Da Vinci SI system and we attempt a robotic approach in all referrals.
The primary surgeon has completed an international robotic colorectal fellowship in UK and is a qualified member of the European Academy of Robotic Colorectal Surgery (EARCS).
We have a dedicated same theatre team and we use a single side docking technique and standardized technique, as described by the European Robotic group.
All patients are within an established ERAS Protocol.
Patients with any of the following characteristics were defined as high risk: a body mass index ≥ 30, male gender, previous MI, preoperative chemoradiotherapy, tumour < 8 cm from the anal verge and previous abdominal surgery.
Results: 30 high risk patients are included so far 28 patients (90%) had cancer (9 right colon cancer and 19 had rectal cancer), 1 had a reversal of Hartmann’s after 2 previous emergency laparotomies and one had multiple polyps from peutz-jegers syndrome.
All patients are ASA II or III and 70% of them had previous abdominal surgeries through an open approach.
The median age is 72 y.o (43–82) and BMI is 29 mg/m2(20–43).
The length of stay is 3 days (2–26). We had 2 serious complications (Clavien-Dindo IIIc and IV); this was one death from pulmonary embolism and one return to theatre due to obstructive ileus.
We perform complete mesocolic excision with central vascular ligation and D3 lymphadenectomy for right colon cancers;
The median lymph node harvested is 25 for the whole group (15–31) and 38 (35–48) for the subgroup of CME with D3 patients. Quality of total mesorectal excision is grade I or II in all patients and all patients had a negative CRM.
The data are monitored due to participation in European collaborations.
Conclusion: Setting up a specialized robotic colorectal center for high risk patients needs to follow specific protocols and training of surgeons and staff, so robotic surgery can be safely performed in high risk patients with excellent oncologic and short term outcomes.
Colorectal—malignant
O214—Effect of the level of ligation of inferior mesenteric artery on functional outcomes in rectal resection: systematic review & meta-analysis
Yegor Tryliskyy1, C.S. Wong2, I. Demykhova3, A. Kebkalo4, V. Poylin5
1North Bristol Trust, NHS, Division of Gastrointestinal Surgery, United Kingdom. 2University of Edinburgh, Surgery, United Kingdom. 3University of South Wales, Health Sciences, United Kingdom. 4Shupyk National Medical Academy of Postgraduate Education, Surgery, Ukraine. 5Northwestern Medicine, Chicago, IL, Surgery, USA
Introduction: Several studies have evaluated the influence of the level of ligation of inferior mesenteric artery (IMA) in rectal cancer surgery on incidence of early postoperative complications and survival. Existing evidence has been summarized by a number of systematic reviews. This systematic review and meta-analysis studied the role of high (HT) versus low (LT) IMA tie on defaecatory, sexual and urinary dysfunctions in patients who had undergone resection for rectal cancer (RR).
Methods: A systematic literature searches of databases (EMBASE, MEDLINE, PubMed, CINAHL) were conducted according to the Preferred Reporting Items for Systematic Reviews and Meta-Analysis (PRISMA) guidelines using predefined terms. Randomized controlled trials (RCTs) comparing HT and LT of IMA in AR were identified and retrieved. Those studies that compared functional outcomes between two surgical techniques were analyzed. Random effects modelling to summarize statistics was performed using Review Manager 5.3 software. The risk of bias was assessed using Cohrane’s Risk of Bias tool 2 (RoB2).
Results: Three RCTs with 360 patients were included. One study examined genitourinary (sexual, urinary) outcomes only, one study examined defaecatory function only, one study examined both genitourinary and defeacatory functions. Methodological quality of these RCTs ranged from moderate (some concerns) to high. Functional outcomes that were reported by at least two studies were: International Consultation on Incontinence Questionnaire (ICIQ), International Index for Erectile Function (IIEF), Jorge–Wexner incontinence score (J-W). These outcomes were included in meta-analysis. Significant difference was observed in urinary continence (ICIQ) at nine months after surgery favoring LT (Standard Mean Difference: -0.66; 95% Confidence Intervals (CI): -0.92, -0.40; Overall effect (OE): Z = 5.01 (P < 0.00001), I2 = 0%). LT was also found to provide better male sexual function preservation (IIEF) at nine months (Mean Difference: 6.31; CI:2.55, 10.07; OE: Z = 3.29 (P = 0.001), I2 = 14%). There was no difference in fecal continence at twelve months (J -W) between two groups. The main limitation of the study was clinical heterogenity.
Conclusions: Low ligation of inferior mesenteric artery has beneficial effects on genito-urinary, but not defecatory function when compared to high ligation in rectal cancer surgery. These conclusions are limited by few well design studies and lack of coordinated measurement and reporting of functional outcomes. More high quality randomized patient controlled trials are required.
Figure 1: International Index of Erectile Function score at nine months after anterior resection

Figure 2: International Consultation on Incontinence Questionnaire (ICIQ) score at nine months after anterior resection.

Figure 3: Joger–Wexner score at twelve months after anterior resection

Colorectal—malignant
O216—Function and complication outcomes of the different reconstructive techniques after radical rectal cancer resection
Edoardo Forcignano'1, S. Pucciarelli3, R. Cirocchi4, R. Passera2, M. Morino2
Città della Salute e della Scienza, 1Department of Surgical Sciences, 2Division of Nuclear Medicine, University of Torino, 3University of Padua, Department of Surgical Oncology and Gastroenterology—Padua, 4University of Perugia, Department of General Surgery—Terni, Italy
Aim: To compare surgical and functional results of different reconstructive techniques after TME for rectal cancer.
Methods: CENTRAL, MEDLINE, Embase, ICTRP Search Portal and three trials registers were searched on 8 January 2021, together with reference checking, citation searching and contact with study authors to identify additional studies. Two review authors independently scanned the title and abstract of every record retrieved to identify randomised controlled trials (RCTs) comparing at least two different anastomotic techniques in terms of function and/or complication outcomes after TME for rectal cancer. We used standard methodological procedures expected by Cochrane. We calculated the risk ratio (RR) for dichotomous outcomes, or the mean difference (MD) for continuous variables, and the corresponding 95% confidence interval (CI). We primarily used a random-effects model for pooling data.
Results: 34 reports of 31 RCTs met the inclusion criteria and were included in the analysis. However, the analysis of the differences between techniques is undermined by the numerous biases in conducting the studies. Only 26% described concealed allocation, while all the trials were exposed to performance bias and only 25% of trials adequately blinded the outcome assessor. The baseline demographic data, including age, gender, tumour stage, tumour level, anastomotic level, diverting ileostomy and pre/post-operative chemotherapy and/or radiotherapy, were comparable between the groups as reported in most of the trials. Colonic J pouch (CJP) was associated with a lower bowel frequency, when compared to straight coloanal anastomosis (SCA) < 8 months postoperatively (MD -2.43, 95% CI -3.80 to -1.06; 10 studies; 625 participants; moderate certainty evidence), which was confirmed > 18 months after bowel restoration (MD -0.95, 95% CI -1.70 to -0.19; 8 studies; 499 participants; moderate certainty evidence). Similarly, CJP was associated with a lower intake of anti-diarrheal medications than SCA > 18 months (RR 0.31, 95% CI 0.14 to 0.71; 4 studies; 215 participants; moderate certainty evidence) after bowel restoration. CJP was associated with a lower incidence of faecal urgency when compared to side to end anastomosis (STE) both in the short term (< 8 months) (RR 0.64, 95% CI 0.42—0.97; 6 studies; 343 participants; moderate certainty evidence) and in the long term (> 18 months) (RR 0.54, 95% CI 0.32—0.92; RR 2.15, 95% CI 1.58 to 2.94; 5 studies; 172 participants; moderate certainty evidence). No differences in perioperative complications were recorded, but a possible higher incidence of anastomotic leak was seen in the SCA group compared to STE (RR 5.78, 95% CI 1.58 to 21.17; 2 studies; 158 participants; low certainty evidence).
Conclusions: There is limited evidence suggesting that after low anterior resection for rectal cancer, reconstruction with CJP results in superior short-term and mid-term functional outcomes compared to SCA and both short-term and long-term functional outcomes in comparison to STE. No other differences in functional and surgical outcomes were observed among groups other than a possible higher incidence of anastomotic leak in the SCA group than STE.
Colorectal—malignant
O217—Colon capsule endoscopy versus computed tomographic colonography for identifying colorectal cancer and polyps: a systemic review and meta-analysis
Ashutosh Gumber1, G. Kumar2, S. Narayanasamy3, A.R. Aspari4, V. Ramesh5, K. Shalli1
1NHS Lanarkshire, Colorectal surgery, 2Royal Bolton Hospital, Colorectal surgery, 3Queens Hospital Burton, Colorectal surgery, 4Southend University Hospital, Colorectal Surgery, 5Broomfield Hospital, Colorectal Surgery, United Kingdom
Introduction: Colorectal Cancer is the third commonest cancer and ranks second in cancer-related deaths worldwide. It is imperative to diagnose the condition in the initial stages for early treatment and improved outcomes. Colonoscopy is a gold standard investigation, but it is an invasive procedure and has failure and incompletion rates with aerosol-generation risk. Computed Tomographic Colonography, the second investigation, is limited by radiation exposure and aerosol generation. Colon Capsule endoscopy is a novel technique without gas insufflation, therefore avoiding discomfort and aerosol generation. Current evidence favoured the CCE use, but the literature behind this is still in the infancy stages. This review aims to compare the yield of the CCE with CTC in CRC and polyps in patients with positive stool tests or diagnosed colorectal lesions.
Method: Review followed PRISMA standards. The electronic database searched for RCTs and observational studies. MedCalc Statistical Software version 17.2.1 used for the synthesis of results. Primary (Per-Lesion and Per-Patient sensitivity analysis) and secondary (Other lesion and completion rate sensitivity analysis) outcomes measured using a random-effect model.
Results: We found one RCT and three prospective observational studies, enrolling a total of 237 patients. Per-Lesion Sensitivity Analysis of CCE versus CTC showed overall effect of 1.903 (0.990- 1.937), p-value-0.057. Per-Patient Sensitivity Analysis showed overall effect of 1.928 (0.995–1.892), p-value-0.054. Other lesions Sensitivity Analysis showed overall effect of 0.810 (0.121–161.995), p-value-0.418. Completion Rate Sensitivity Analysis showed overall effect of -0.419 (0.526–1.516), p-value-0.676. None of the primary and secondary outcomes showed significant results between CCE and CTC.
Conclusions: CCE had a better detection rate for colorectal cancer and polyp than the CTC, but this was not statistically significant. Therefore, this study failed to prove CCE's superiority over CTC. Considerable variability noted in the included studies with the inadequate quality and lacunae in the data. Initial studies revealed promising results of CCE, but they had a low level of evidence. A careful decision must be taken in the current COVID-19 pandemic since its advantage of zero aerosolisation. Researchers should focus on innovation in techniques and simultaneous high-quality studies to evaluate them.

Colorectal—malignant
O242—Safety of transanal endoscopic microsurgery in rectal polyps excision after attempt of endoscopic removal
Monica Ortenzi1, E. Forcignanò2, A. Arezzo2, G. Pentassuglia2, F. Marinucci1, R. Ghiselli1, M Morino2, M. Guerrieri1
1Università Politecnica delle Marche, Clinica chirurgica, 2University of Torino, Department of Surgical Sciences, Italy
Introduction: Nowadays, endoscopy continuously increases operations and the indication to Transanal Endoscopic Microsurgery (TEM) to clean up the site of a previous endoscopic resection with a full thickness removal in case of an unexpected malignancy is often questioned. The aim of the study is to show the results of TEM after endoscopic resection of rectal polyps. .
Methods: We merged two prospective databases of patients undergoing TEM after endoscopic excision of rectal polyps between January 2011 and June 2020. Indications for performing TEM were recorded as well as the number of any previous endoscopic removal attempts. The type of operation performed, the intraoperative and postoperative complications, the postoperative histology, the need for radical rescue surgery were also considered. Statistical analysis also included analysis of patient characteristics and assessment of the relapse rate after treatment. The analysis was conducted according to the intention to treat principle.
Results: We included 150 patients who underwent TEM after endoscopic resection for rectal cancer. In 133 patients (88.6%), the tumor was removed with a piece meal technique. The median value of the maximum diameter of the endoscopically excised lesion was 3 cm (IQ = 2–4). In 101 patients (67.3%) the TEM indication was the radicalization of the endoscopic excision of an unexpected cancerous polyp on definitive histological examination. In 49 patients (32.7%) the indication was the completion of one or more removal attempts that could not be completed endoscopically. The median operative time was 45 min (IQ = 35–65). In 4 patients (2.6%), accidental opening of the peritoneum was observed during surgery, sutured transanally in all cases without sequelae. No intraoperative complications were reported. In the postoperative period, complications occurred in 18 patients (12%): 8 type I, 6 type 2, 4 type 3a, according to Dindo Clavien classification. The definitive histological examination after TEM resulted in 25 cases (16.7%) carcinoma (4 pT1, 20 pT2, 1 pT3), in 54 cases (42.7%) adenoma (32 severe dysplasia, 22 mild dysplasia), in 71 cases (40.6%) fibrous tissue. Rescue surgery was performed in 8 patients (5.3%), 5 of whom were found to have additional neoplastic tissue (3 pT3N0, 1 pT2N2a, 1 pT0N1). None of them demonstrated disease recurrence at a minimum follow-up of 7 months (median 78 IQ = 54—101 months). With a minimum follow-up of 6 months a relapse of neoplastic tissue after TEM occurred in 7 patients (4.6%), in 2 cases in the form of dysplasia treated with TEM, in 4 cases in the form of carcinoma, treated in 2 cases with anterior resection and in 2 with radiotherapy for palliative purposes for the age of the patient. An additional patient was lost to follow-up.
Conclusions: TEM represents a valid alternative to endoscopic resection and offers the possibility of therapeutic completion after insufficient treatment by flexible endoscopy. Having minimal impact, the present experience demonstrates how TEM in most cases allows to avoid radical surgery significantly improving patients' quality of life.
Colorectal—malignant
O243—Impact of tumor location in early-onset colorectal cancer: analysis of 344 patients in a tertiary center
Caterina Foppa, S. Tamburello, A. Maroli, F. Carrano, M. Carvello, A. Spinelli
Humanitas Clinical and Research Center—IRCCS, Division of Colon and Rectal Surgery, Italy
Aim: The study aims to analyze demographics, pathology data, molecular pattern, and outcomes of Early Onset Colorectal Cancer (EOCRC), according to tumor location (right colon-RC vs left colon-LC vs rectum-R), and age of onset (< 39 vs 40–49).
Methods: 344 EOCRC operated between January 1st, 2008- September 30th, 2020 were included and analyzed according to tumor site (RC vs LC vs R) and age groups (< 39 vs 40–49). For each site group, age stratification (< 39 vs 40–49) was performed.
Results: RC were 79 (31.7% < 39), LC 127 (28.4% < 39), and R 138 (34.1% < 39). Baseline characteristics were comparable among groups, except for female gender, predominant in LC (p = 0.021). RC showed a higher rate of mucinous tumors (31.6%, p < 0.0001), with high grade of differentiation (13%, p = 0.001), a higher proportion of microsatellite instability (MSI) (25.4%;p < 0.0001), and consequently of genetic syndromes (25.3%; p = 0.004). LC had a higher proportion of nodal (58.3%; p = 0.015) and distal metastases (LC 45.6%; p = 0.002). Low grade of differentiation was more observed in R (p = 0.001). The rate of KRAS, NRAS, BRAF, Pik3ca mutations was comparable. Cancer-Specific Survival (CSS) and Disease-Free Survival (DFS) were comparable among the groups at a mean follow-up of 60 months.
After age stratification (< 39 vs 40–49), LC presented with more highly differentiated (p = 0.004) and stage-1 tumors (p = 0.027) in the 40–49 group (p = 0.047). A higher rate of obesity (p = 0.041), MSI (p = 0.001) and genetic syndromes (p = 0.001) was observed in R < 39. Overall, patients < 39 had a lower CSS (p = 0.02). The variables associated to disease recurrence or progression at logistic regression were stage-4 disease (p = 0.002); nodal (p < 0.0001) or distant metastases (p < 0.0001); mutations (p < 0.0001); BMI (p = 0.010); adjuvant therapy (p < 0.0001). Family history and MSI were protective factors (p = 0.018; p = 0.004).
Variables associated to death were age < 39 (p < 0.0001), nodal (p < 0.0001) or distant metastases (p < 0.0001); mutations (p < 0.0001); adjuvant therapy (p < 0.0001).
Conclusions: EOCRC is more frequent in LC and R. CRC in people aged < 39 had a worse CSS compared with 40–49 group. Age < 39 was an independent risk factor for death.
Colorectal—malignant
O244—Early inflammatory biomarkers as predictive factors for freedom from infection after colorectal cancer surgery: a prospective Cohort study
Maria Sousa1, P. Leão2, A. Goulart2
1Hospital Braga, General Surgery, 2Hospital Trofa Saude, General Surgery, Portugal
Purpose: Different biomarkers are useful in diagnosing infections. The aim of this work was to clarify the relation between different inflammatory biomarkers (white blood cell [WBC] count, C-reactive protein [CRP], procalcitonin [PCT], and C-reactive protein-to-albumin ratio [CAR]) and early infectious complications after colorectal surgery.
Methods: This prospective single-center cohort study included 130 patients undergoing elective colorectal surgery. The WBC count, CRP, and PCT were measured at post-operative day one (POD1) and POD3 and albumin on POD3.
Results: Patients with surgical site infections (SSI) exhibited significantly higher CRP concentrations on POD1 and CRP and CAR on POD3 than did patients without SSI. According to receiver operating characteristic analysis, the CRP concentration on POD1 and the CRP and CAR on POD3 showed the highest area under the curve (AUC) for predicting SSI (AUC 0.639, 0.736, and 0.729, respectively). Multivariable logistic regression analysis showed that CRP on POD1 and CRP and CAR on POD3 were independent predictors of SSI (odds ratio 7.355, 7.605, and 8.337, respectively).
Conclusions: The CRP concentration on PO1 and CRP and CAR on POD3 can positively identify patients at low risk of SSI. They can be used as a prognostic tool to predict an uneventful post-operative period and therefore have been incorporate into our discharge criteria after elective colorectal resection, improving clinical decision-making.
Colorectal—malignant
O245—Impact of enhanced recovery after surgery (ERAS) program on clinical outcomes after elective colorectal surgery in a rural hospital
Antonio Pesce1, M. Portinari3, N. Fabbri1, V. Sciascia1, L. Uccellatori1, L. Sattin1, M. Vozza2, E. Righini2, C.V. Feo1
Ospedale del Delta, Azienda Unità Sanitaria Locale di Ferrara, University of Ferrara, 1Department of Surgery, 2Department of Emergency, 3University of Ferrara, Department of Surgery, Italy
Aims: The main purpose was to determine the impact on postoperative outcome of a standardized enhanced recovery program for elective colorectal surgery in a rural hospital.
Methods: A prospective series of patients (N° = 80) undergoing elective colorectal resection completing a standardized ERAS protocol in 2018–2020 (ERAS group) was compared to patients (N° = 80) operated at the same rural hospital in 2013–2015 (pre-ERAS group). The exclusion criteria for both groups were: ASA score IV, TNM stage IV, inflammatory bowel disease, emergency surgery and rectal cancer. The primary outcome was hospital length of stay which was used as an estimate of functional recovery. Secondary outcomes included: postoperative complications, 30-day readmission, mortality and factors predicting prolonged hospital stay. Data were analyzed by intention-to-treat, using chi-square, t-Student, Mann–Whitney, and log-rank tests. Cox regression analysis identified independent predictors of prolonged hospital length of stay.
Results: Age, gender and BMI were comparable in both groups. Laparoscopic approach was performed in 95% of patients in the ERAS group vs 0% in pre-ERAS group. The median adherence to ERAS protocol was 68% as opposed to 12% of the retrospective control group. The median length of stay in ERAS-group was 5 days (4–7 days) versus 10 days (9–14 days) in the pre-ERAS group. After adjusting for potential confounders, following a conventional perioperative protocol was the only independent factor predicting a prolonged hospital length of stay (p < 0.0001). Moreover, ERAS protocol determined a reduction of 31% of post-operative complications. No statistically significant differences in mortality and 30-days re-admission rates were found between the two groups.
Conclusions: Although limited hospital resources are perceived as a barrier to ERAS implementation, the current experience demonstrates how the use of an ERAS program in a rural area is feasible and effective, despite it requires greater effort. Implementing a safe ERAS protocol in elective colorectal surgery: 1) significantly reduced time to functional recovery and postoperative hospital length of stay; 2) reduced post-operative complications and 3) did not increase mortality and 30-day readmissions.
Colorectal—malignant
O246—C-reactive protein following major abdominal surgery in daily practice
Victor Plat, D. Voeten, F. Daams, D.L. van der Peet, J. Straatman
Amsterdam UMC, Gastrointestinal surgery, The Netherlands
Background: Infectious complications are frequently encountered after abdominal surgery. Early recognition, diagnosis and subsequent timely treatment is the single most important denominator of postoperative outcome. This study prospectively addresses the predictive value of routine assessment of C-reactive protein (CRP) levels as an early marker for infectious complications following major abdominal surgery.
Methods: Consecutive patients undergoing major abdominal surgery between November 2015 and November 2019 were prospectively enrolled. Routine CRP measurements were implemented on postoperative day three, four and five, additional computed tomography examinations were performed on demand. The primary endpoint was the occurrence of Clavien-Dindo grade three or higher infectious complications.
Results: Of 350 patients, 71 (20.3%) suffered a major infectious complication, median time to diagnosis was seven days. CRP levels were significantly higher in patients with major infectious complications compared to minor or no infectious complications. The optimal cut-off was calculated for each postoperative day, being 175 on day three, 130 on day four and 144 mg/L on day five, corresponding sensitivities, specificities, positive and negative predictive values were over 80%, 65%, 40% and 92% respectively. Alternative safe discharge cut-offs were calculated at 105, 71 and 63 mg/L on day three, four and five respectively, each having a negative predictive value of over 97%.
Conclusions: The CRP cut-offs provided in this study can be used as a discharge criterion, or to select patients that might require an invasive intervention due to infectious complications. These diagnostic criteria can easily be implemented in daily surgical practice (Table 1).
Table 1.
Optimal CRP cut-offs to distinguish between patients with and without major infectious complications. Next to the optimal cut-offs, cut-offs for safe discharge are provided.
| Optimal cut-off | Cut-off | Sensitivity (%) | Specificity (%) | PPV (%) | NPV (%) | LR + | LR- |
|---|---|---|---|---|---|---|---|
| Postoperative day 3 | 175 | 80.0 | 69.7 | 40.% | 93.2 | 2.64 | 0.29 |
| Postoperative day 4 | 130 | 82.1 | 66.9 | 41.0 | 93.0 | 2.48 | 0.12 |
| Postoperative day 5 | 114 | 80.6 | 70.5 | 45.8 | 92.2 | 2.73 | 0.28 |
| Safe discharge criterion | |||||||
| Postoperative day 3 | 105 | 95.7 | 39.1 | 28.6 | 97.3 | 1.57 | 0.11 |
| Postoperative day 4 | 71 | 95.5 | 38.1 | 30.1 | 97.8 | 1.54 | 0.02 |
| Postoperative day 5 | 63 | 94.0 | 50.2 | 33.2 | 97.7 | 1.61 | 0.08 |
NPV indicates negative predictive value; PPV, positive predictive value; LR, likelihood ratio

Colorectal—malignant
O247—Quantitative analysis of 18FDG-PET/MRI to assess pathological complete response following neoadjuvant radiochemotherapy in locally advanced rectal can
Valentina Ferri1, E. Vicente1, Y. Quijano1, H. Duran1, E. Diaz1, I. Fabra1, R. Caruso1, L. Malave1, R. Agresott1, P. Ruiz1, G. De Nobili2, V. Nola3
1HM Sanchinarro University Hospital, General Surgery, Spain. 2Chieti University, General Surgery, 3Pavia University, General Surgery, Italy
Back ground: The role of 18-FDG-PET/MRI in detection of pathlologic complete response (pCR) after neoadjuvant radiochemiotherapy (RCT) in locally advance rectal cancer (LARC) is still unclear. PET/MRI is supposed to add metabolic information to morphologic MRI study and may improve the differentiation of fibrotic versus tumor tissue after RCT.
The aim of this study is to report our experience with PET/MRI to asses the response to neoadjuvant treatment in patient with LARC.
Material and methods: Patients with LARC were prospectively enrolled and restaged with PET/MRI 8 weeks after completing RCT. PET/MRI findings were correlated with presence /abscese of tumore response (pCR/no-pCR) and tumor regression grade (TRG) at histopathology examination. Apparent diffusion coefficient (ADC) and standardized uptake value (SUV) were considered for the quantitative analysis. The study was approved by the institutional review board and written informed consent was obtained.
Result: Thirty patiens were enrolled. PCR occured in 23,3% (7/30). Sensitive, specificity and accuracy of PET/MRI for the detection of pCR was 0.91, 0.85 and 0.90 respectively.
The pCR ADC-median value was 1.22 × 10–3 mm2/s and the no-pCR ADC-median value was 0.75 × 10–3 mm2/s (un- paired t test, p < 0.01). The pCR SUV-median value was 4.14 and the no-pCR SUV-median value was 6.81 (un- paired t test, p < 0.05). Analyzing the distribution of the post-RCT ADC and post-RCT SUV and the TRG in the finally histological examination we found a significant statistical correlation for ADC (Spearman’s Rho = -0.695) and for SUV (Spearman’s Rho + 0.529). The ROC curve for ADC, SUV and the hybrid curve of ADC + SUV were able to predict the pCR with an area under the curve (AUC) of 0.904, 0.748 and 0.913 respectively.
Conclusion: 18- FDG PET/MRI is a promising imaging modality in prediction of response to CRT in patients with LARC.
Keywords: locally advanced rectal cancer, 18-FDG-PET/MRI, pathologic complete resonse, neoadjuvant radioquimoiterapy.
Colorectal—stoma
O011—Stoma-APPtimize: improving the self-efficacy and supporting self-confidence of patients having a stoma using an evidence-based, mobile app
Sebastiaan van der Storm, C. Buskens, W. Bemelman, M. Schijven
Amsterdam UMC, location AMC, surgery, The Netherlands
Background: Having to live with a stoma is known to result in a negative impact on the self-image, daily functioning and the quality of life. Especially in the first period after the operation, patients have to adapt to the new situation. Coping with a stoma might be difficult for patients and may result in insecurities. Insecurities are reported to lead to a variety of psychosocial problems such as depression, stress, anxiety, reduced physical activity and social participation and sexual problems. Patients are at risk to encounter specific stoma-related morbidity; the incidence varies from 20–80%; with skin irritation and leakage as most common complications. Self-efficacy is known to be associated with a reduction of aforementioned psychosocial problems and stoma related morbidities. Hence, tailored patient education and guidance is of crucial importance both in the preoperative as in the immediate postoperative period.
Methods: A multicenter randomized controlled trial will be conducted. Patients undergoing elective or emergency colorectal surgery ending in an ileostomy or colostomy, who are 18 years or older and in possession of an eligible smartphone, will be included. Participants of the trial-arm will receive the full version of the application, containing personalised and timed guidance and information -such as operation-specific information and the associated care path. Also, they have access to a peer-support platform.
Patients in the control group will receive a restricted version of the application- without the personalised and timed guidance and information. Patients in the control group do not have access to the peer-support platform.
The primary outcome is quality of life. Secondary outcomes are Reported Outcome Measures (PROMs) as patient satisfaction and psychological adaption will be evaluated as well as number of complications, readmittance and reoperations rates and the length of hospital stay.
Results: The enrolment of patients started in March 2021 and is anticipated to be completed in 2 years. We hypothesise that patients supported by the intervention version of the app will report a significantly higher quality of life than patients having a stoma who are supported by the control version of the app, not being offered personalised and timed guidance and information, nor having access to peer-support in the app.
Conclusion: Conclusions are to be drawn when data analysis is completed.
Disclosure of Interest: None declared
Colorectal—stoma
O012—Stenting for Stoma stenosis in an unfit patient: A novel endoscopic technique for unsolved challenge
Ashutosh Gumber, A. McLeary, M. Patterson, K. Shalli
NHS Lanarkshire, Colorectal surgery, United Kingdom
Introduction: Stoma stenosis is an uncommon but challenging complication faced by the surgeon and patient. Lack of blood supply, obesity, emergency surgery and challenges in maturing the stoma leads to stoma stenosis in up to 9% of the patients. Chances of stenosis with colostomy have been reported higher than ileostomy in the medical literature. Due to rarity of this complication, there is paucity in the literature and a lack of evidence for appropriate management. Often, it mandates an early or delayed surgery for refashioning the stoma, which can be difficult in unfit patients. The aim of reporting this case is to present a newer endoscopic technique of stenting the stenosed stoma as another option for treatment.
Methods: A 61-year-old hypertensive and diabetic gentleman with a BMI of 52 underwent difficult laparoscopic abdominoperineal excision of low rectal tumour following neoadjuvant therapy. The creation of stoma was challenging due to bulky colon and it’s mesertery and the abdominal wall thickness of 118 mm at the pre-marked site in the left abdomen. As per the standard approach, end colostomy was spouted by 1 cm above the skin. Patient developed stoma necrosis in the immediate post-operative period and subsequently severe stenosis. Re-operation was not possible due to body habitus and co-morbidities. A local revision with multiple radial incisions (Fig. 1) followed by insertion of uncovered self expanding Biodegradable (BD) stent (Fig. 2) next day achieved reasonable dilatation. The stent had a diameter of 31 mm and length of 60 mm. Top end of the stent was kept at the level of the mucocutaneous junction.
Results: Challenging major re-operation avoided following a successful novel stenting approach. The stent dissolved in 3 months. Patient continued with dilators subsequently and has a stomal opening of 2.5 cm, nine months following the surgery. Further intentional weight loss by 15 kg over the last six months has helped.
Conclusion: Stoma stenosis is a rare condition, and the treatment is often demanding. As an additional tool to deal with such complication, BD stenting proved to be rewarding. It has been therapeutic in this case, but it can certainly allow time for a planned revision or closure of the stoma later.


Colorectal—stoma
O109—Prophylactic NPWT at ileostomy closure in patients after colorectal cancer operation reduce surgical site infection incidence—RCT
Mateusz Wierdak, M.A. Pisarska-Adamczyk, M. Wysocki, P. Major, K. Kolodziejska, T. Vongsurbchart, M. Nowakowski, M. Pedziwiatr
Jagiellonian University Medical College, 2nd Department of Surgery, Poland
Aims: We performed a randomized control trial to assess the usefulness of postoperative NPWT in the reduction of postoperative wound healing complications and surgical site infections after diverting ileostomy closure, in the group of patients previously operated for colorectal resection due to cancer. Cost effectiveness was also assessed.
Methods: Prospective, randomized study between January 2016 and December 2018 was conducted. Patients with a past history of laparoscopic colorectal surgery due to cancer with protective loop ileostomy scheduled to undergo ileostomy closure with primary wound closure were randomly divided into groups with or without NPWT. The primary endpoint was the incidence of wound-related complications (WRC) (wound healing complications witch required surgical intervention other than suture removal or dressing changing). The secondary endpoints were incidences of Surgical Site Infection (SSI),the length of postoperative hospital stay (LOS) and length of complete wound healing (CWH). Cost analysis was also performed.
Results: A total of 36 patients with only primary wound closure (single skin sutures (SSS)) and 35 patients with SSS + NPWT were enrolled. WRC was observed in 11 patients in the SSS-only group, and 3 patient in the SSS + NPWT group (p = 0.0199). Difference in SSI incidence (8 in SSS group and 2 in SSS + NPWT group) (p = 0.0455) and median CWH [7 (7–15,5) days in SSS-only group; 7 (7–7)days in SSS + NPWT group; p = 0.0302] was also statistically significant. There was no difference in LOS between the two groups [median LOS: SSS alone—3 (2,5–5) days; SSS + NPWT 4 (2–4) days; p = 0,0719].We observed also reduction of global cost of treatment. The summarized additional cost of postoperative care per capita was found to be 170 € in NPWT group and 370 € in control group with Polish healthcare.
Conclusion: Prophylactic postoperative NPWT after diverting ileostomy closure in colorectal cancer patients reduces the incidence of WRC, SSI, and CWH and is also cost-effective.
Hepato-biliairy & pancreas—gallbladder
O065—Morbidity following emergency and elective cholecystectomy: a retrospective comparative cohort study
James Lucocq, G Radhakishnan, J Scollay, P Patil
Ninewells Hospital, Hepatopancreaticobiliary, United Kingdom
Introduction: Emergency laparoscopic cholecystectomies (LC) performed during an acute episode can be challenging due to acute inflammation but reduces the risk of further biliary pathology. The World Society of Emergency Surgery (WSES) and the updated Tokyo guidelines advise early cholecystectomy in emergency patients and for mild acute cholecystitis. A comprehensive comparison of post-operative outcomes between emergency and elective LCs has never been conducted and the relative morbidity associated with early cholecystectomies remains uncertain. Our aim was to compare post-operative outcomes between emergency and elective LCs to evaluate current practice.
Method: Emergency and elective LCs performed for biliary pathology across three surgical units between January 2015 and January 2020 were included in the study. The surgical units were located in a defined geographical region with a stable population of more than 416,090 people, based on mid-year 2017 population estimates, and less than a 1% migration rate. An emergency cholecystectomy was defined as an immediate, urgent (< 24 h) or expedited (< 5 days) cholecystectomy with reference to the NCEPOD classification. Data was collected retrospectively from multiple regional databases using a deterministic records-linkage methodology. Complications, further imaging and interventions were recorded for post-operative stay and re-admissions over a 100-day follow-up period and rates of outcomes were compared between emergency and elective groups using univariate analysis.
Results: Over the five-year period, 2775 cholecystectomies were performed (median age, 53 years; range, 13 – 92; Male:Female, 1:2.7). Emergency and elective cholecystectomies were performed in 20.5% and 79.5% of cases, respectively. The rate of post-operative complications in the emergency and elective cholecystectomy groups were 14.1% and 6.8%, respectively (p < 0.00001) (retained stones, p < 0.00001; collections, p = 0.02; bile leaks; p = 0.0003). Median post-operative stay in the emergency group was longer (p < 0.00001) and the emergency group had a higher rate of prolonged stay (≥ 3 days; p < 0.00001). Fifteen percent of patients were re-admitted in the emergency group versus 6.1% in the elective group (p < 0.00001). Patients in the emergency group were more likely to require post-operative imaging and intervention (p < 0.00001).
Conclusions: Despite current guidance, an emergency cholecystectomy remains a morbid procedure and we demonstrate an increased risk of emergency LC versus elective LC. The increased risk of an emergency LC needs to be weighed up against the risk of further attacks from biliary pathology until elective surgery. Our data indicates that we need to readjust our selection criteria for the ‘emergency cholecystectomy patient’ and identify patients who will specifically benefit from earlier surgery.
Hepato-biliairy & pancreas—gallbladder
O066—Expectant management of acute cholecystitis within the SARS-CoV-2 pandemic: does it work?
James Butterworth, B. Dayment, R. Kerwat
Queen Elizabeth Hospital, Woolwich, General Surgery, United Kingdom
Introduction: The SARS-CoV-2 pandemic has placed unprecedented strain on health care systems internationally. All experts continue to advocate in-patient laparoscopic cholecystectomy for acute cholecystectomy, in many centres in the UK this has not bee feasible due to shortage of resources due to the pandemic. We present the results of a carefully constructed treatment algorithm utilising intravenous antibiotics, percutaneous cholecystostomy, ERCP and elective surgery.
Method: Retrospective notes review of 31 patients presenting with acute cholecystitis to a district general hospital over a 3 month (October to January 2021).
Results: The cohort included 31 patients with median age 67 (range 20–95), male:female ratio 10:21, ASA grade 1 (range 1–3). Biochemical markers of infection were assessed and median white cell count was 12.7 109/L (5.4–34.7), median CRP 95 mg/L (2–395), bilirubin 18 umol/L (4–125). Imaging modalities required for diagnosis included ultrasound in 25 patients (81%), computer tomography of abdomen and pelvis (CTAP) for 19 (61%) and 9 (29%) patients required a magnetic resonance cholangiopancreatography (MRCP). Median Tokyo severity grading of our patient cohort was 2 (1–3). 8 (26%) patients required percutaneous cholecystostomy insertion at a median of 2 days from admission (range 1–10) and 16 (52%) were booked for elective cholecystectomy. Endoscopic retrograde pancreatography (ERCP) was required for 7 (23%) of patients. 28 patients recovered well with no complications, 3 patients had minor (Clavien-Dindo 2) complications and there was 1 (3.2%) mortality from SARS-CoV-2 related complications. Median length of stay was 6 days (1–33).
Conclusion: During the SARS-CoV-2 pandemic with limited surgical theatre resources stretched to their maximum capacity, expectant management utilising intravenous antibiotics, percutaneous cholecystostomy, ERCP and elective cholecystectomy is an appropriate treatment algorithm with acceptable short-term outcomes.
Hepato-biliairy & pancreas—gallbladder
O067—The outcome of laparoscopy-assisted transgastric rendezvous ERCP during cholecystectomy after Roux-en-Y gastric bypass compared to normal controls
Sofia Liljegard, Å. Fredriksson, T. Manke, A. Kylebäck, P.A. Larsson, E. Haraldsson
Skaraborg Hospital Skövde, Department of Surgery, Sweden
Introduction: Rendezvous ERCP (RV-ERCP), with a guidewire placed through the cystic duct, is a commonly used technique to treat common bile duct stones (CBDS) discovered during laparoscopic cholecystectomy (LC). The rapid weight loss in combination with altered gallbladder function after bariatric surgery has been shown to increase the risk of CBDS and the altered anatomy after Roux-en-Y gastric bypass (RYGB) poses a challenge when endoscopically treating those. Laparoscopy-assisted transgastric RV-ERCP (LAERCP) is a possible treatment option. This study compares patients treated with LC and concomitant LAERCP with patients with normal anatomy undergoing LC with RV-ERCP.
Method: Retrospective registry-based case–control study with patients included between 2007 to 2020 at a single institution. Cases and the control patients were matched on sex, age, and procedure year in a 2:1 manner. Outcome measures were CBDS clearance, procedural time, length of postoperative hospital stay, postoperative complications, use of antibiotics, and use of opioid equivalent analgesics.
Result: Fourteen patients with LAERCP and 28 control patients were included. All patients had successful CBDS clearance in one treatment session. There were no adverse events or postoperative complications in either group.
There were few significant differences between the groups. RYGB patients had more medical co-morbidities compared to the controls (p = 0.050) and tended to weigh more than the controls, median 90 vs 83 kg (p = 0.079). The mean time from RYGB to LAERCP was 8 years (range 0–17).
RYGB patients had a longer postoperative hospital stay (median 1 vs. 2 days, p = 0.028) and needed more opioid equivalents post-operatively (p = 0.047). They also had a higher preoperative C-reactive protein level (mean 125 vs 63 mg/L, p = 0,024) and 93% of the RYGB patients were administered preoperative antibiotics compared to 64% in the control group (p = 0.047). Mean procedural time tended to be longer with LAERCP, 128 min (95% CI 98–157) vs. 102 min (95% CI 87–116).
Discussion: LC with rendezvous LAERCP is a feasible treatment option for patients with CBDS after RYGB and comparable to LC with regular RV-ERCP.
Hepato-biliairy & pancreas—gallbladder
O068—Near-infrared fluorescence cholangiography at a very low dose of indocyanine green: a prospective experimental study
Natalia Pujol Cano1, F.C. Molina-Romero1, E.F. Palma-Zamora1, J. Bonnin-Pascual2, M. Coll-Sastre2, F.X. González-Argenté2, J.M. Morón-Canis1
Hospital Universitario Son Espases, 1Hepatobiliary Surgery, 2General Surgery, Spain
Aims: Indocyanine green (ICG) near-infrared fluorescence cholangiography (NIRF-C) is widely used to visualise the biliary tract during laparoscopic cholecystectomy (LC). However, the ICG dose and its dosing time vary in the literature and optimal values remain unclear. The objectives of this prospective experimental study were to optimise the ICG dose and dosing time for ideal visualisation of the biliary anatomy while avoiding hepatic hyperluminescence and to assess the surgeon-perceived benefit.
Methods: Forty-four patients were scheduled for LC. We recorded demographics, surgical indication, intraoperative details, adverse reactions to ICG, hepatic hyperluminescence, visualisation of the cystic duct (CD), the common bile duct (CBD) and the cystic duct-bile duct junction (CDBDJ) before and after dissection of Calot's triangle, operation time, surgical complications and subjective surgeon data. For all procedures, 0.25 mg of ICG was administered intravenously after anaesthetic induction. ICG NIRF-C was performed using the overlay mode of the VISERA ELITE II Surgical Endoscope in all surgeries.
Results: ICG NIRF-C was performed in all 44 cases. The mean operation time was 45 ± 15 min. There were no bile duct injuries (BDIs) or allergic reactions to ICG. The postoperative course was uneventful in all of cases. The mean postoperative hospital stay was 28 ± 4 h. ICG NIRF-C identified the CBD in 100% of the patients, the CD in 71% and the CDBDJ in 84%, with a surgeon satisfaction of 4/5 or 5/5 in almost 90% of surgeries based on a visual analogue scale (VAS) (Table 4). No statistically significant differences were found in the visualisation of the biliary structures after the dissection of Calot’s triangle in obese patients or with gallbladder inflammation. Furthermore, 25% of patients with a BMI ≥ 30, 27% of patients with a Nassar grade ≥ 3 and 21% of patients with gallbladder inflammation had a VAS score 5/5 compared to 6% of patients with a BMI < 30 (p = 0.215), 6% of patients with a Nassar grade < 3 (p = 0.083) and 0% of patients without gallbladder inflammation (p = 0.037) (Table 5).
Table 4.
Correlation between surgeon satisfacion fluorescence imaging according to VAS and visualisation of biliary structures

Categorical values are presented as percentages.
VAS Visual Analogue Scale, CD cystic duct, CBD common bile duct, CDBDJ cystic duct-bile duct junction.
Table 5.
Correlation between surgeon satisfacion fluorescence imaging according to VAS and posible factors affecting th ability ICG-C to delineate biliary structures, n=44

Categorical values are presented as percentages.
VAS Visual Analogue Scale, BMI body mass index.
Conclusions: ICG NIRF-C at a very low dose of ICG enables the real-time identification of biliary ducts, thereby avoiding the hepatic hyperluminescence. The optimal effect of ICG NIRF-C was achieved by injecting 0.25 mg of ICG 20 min before surgery, even in cases of obese patients or those with gallbladder inflammation.
Hepato-biliairy & pancreas—gallbladder
O069—Direct gallbladder indocyanine Green injection technique to achieve critical view of safety in laparoscopic cholecystectomy
Gabriel Cárdenas, I. Fornaguera, R. Díaz del Gobbo, C. Ginestà
Hospital HM Delfos, General and Digestive Surgery, Spain
Aim: Bile duct injury is one of the most severe complications after cholecystectomy. The aim of this video is to demonstrate how an optimal critical view may be achieved by injecting indocyanine green (ICG) directly into the gallbladder with a fine needle technique.
Methods: Twenty-nine patients were prospectively studied in which a laparoscopic cholecystectomy for symptomatic cholelithiasis or acute cholecystitis was performed. ICG was diluted in 10 cc of sterile water and percutaneously injected with laparoscopic direct vision into the gallbladder with a 22G fine needle.
Results: From the 29 patients, 13 were men and 16 women, with a median age of 58 years (26—80) and a body mass index of 24 kg / m2 (21—30). All patients were ASA I-II, being hypertension and type 2 diabetes mellitus the most frequent comorbidities. Surgical indication was symptomatic cholelithiasis in 26 cases and acute cholecystitis in 3. ICG dose varied between 2 and 4 cc. Biliary tree identification was reported. After ICG injection and before starting the dissection the cystic duct was identified in 23 cases, the common bile duct in 18, and the common hepatic duct in 9. After starting the dissection, in all cases the cystic duct was identified, in 27 the common bile duct and in 14 the common hepatic duct. Critical view of safety was achieved in all cases. The median surgical time was 45 min (20—105), without any intraoperative complications. One patient had a trocar hemorrhage as a postoperative complication and all patients had a postoperative stay of 24 h, except for the acute cholecystitis (72 h) and the trocar hemorrhage (5 days).
Conclusions: Direct gallbladder injection of indocyanine green with a fine needle is simple, efficient and shows a real time fluorescent cholangiography and an optimal critical view of safety decreasing the risk of bile duct injury.

Hepato-biliairy & pancreas—gallbladder
O071—In COVID-19 era, Are we compliant with the updated Royal College of Surgeons in England (RCS) guidelines of acute cholecystitis management?
Ahmed Dorra, G. Bisheet, L. Ashley, S. Mallick, W.F. Fahmy
Kettering General Hospital, General surgery, United Kingdom
Aims: Following the strike of the Covid 19 pandemic, the Royal College of Surgeons in England (RCS) issued new guidelines in the management of various surgical diseases in April 2020. The RCS updated acute cholecystitis management guidelines recommended conservative treatment as the first line of management with elective cholecystectomy to be followed after three months. The aim of the study was to assess the adherence of management of acute cholecystitis in a general district hospital to these updated guidelines.
Methods: Retrospective data, using hospital coding system, was collected from 69 patients' medical records ( 29 males and 40 females) who were diagnosed with acute cholecystitis from April 2020 to July 2020 (4 months).
Results: Analysis of the collected data showed that conservative treatment was the main line of treatment in all cases (100%). The rate of readmissions was 38% (26/ 69 patients). Elective admissions for planned cholecystectomy as per guidelines was 20% (14/69 Patients). Conservative treatment succeeded in 88% (61/69 patients) and failed in 12% (8/69 patients) as shown in Fig. 1. Complications occurred in 38% (26/69 patients). Inpatient mortality was 3% (2/69 cases) with no post-discharge 30 days mortality. Cholecystectomy was done in 19/69 patients (14 as elective and 5 as an emergency). Only two patients ( 3%) were COVID positive and were treated conservatively. One stayed for 68 days while the other stayed for 32 days and died. The average hospital stay for all patients was 7.6 days.
Conclusion: There was a high success rate of conservative treatment. However, more than a third of the cases had readmissions due to complications. Hospital stay was markedly increased in cases of acute cholecystitis post-Covid infection. The work recommends establishing a national data set for an insight into the conservative management of acute cholecystitis in view of the national re-admissions and complication rates. Moreover, further studies about the impact of COVID 19 on the prognosis of acute cholecystitis are recommended.

Hepato-biliairy & pancreas—gallbladder
O072—A review of laparoscopic cholecystectomies during the COVID-19 pandemic compared with pre-pandemic. Is there a difference in patient outcomes?
Ahmed Dorra, G. Bisheet, L. Ashley, S. Mallick, W.F. Fahmy
Kettering General Hospital, General surgery, United Kingdom
Aim: In order to deal with the overwhelming burden placed on its services, the COVID-19 pandemic led to dramatic restructuring within the NHS. One sector immensely impacted by the pandemic is elective surgery. Nearly 70, 000 laparoscopic cholecystectomies (LC) are performed annually in the UK and typically, these are performed as elective day cases. Delays in performing LC are associated with recurrent cholecystitis, pancreatitis and cholangitis; all of which have a significant morbidity and mortality risk. This in turn has an economic impact on the NHS.
We aimed to evaluate if patients undergoing LC during the COVID-19 pandemic at our site, had different outcomes compared to those treated prior to the pandemic. Has the COVID-19 pandemic negatively impacted their patient journey? Furthermore, has the pandemic led to increased costs for our site?
Methods: Retrospective data collection was performed to identify all patients who had undergone a LC from March 2019–March 2021. Patients were categorised into ‘pre-COVID’ and ‘during COVID’ groups, these were further subdivided into ‘emergency’ and ‘elective’ cohorts. Length of stay, rate of conversion to open surgery/subtotal cholecystectomy, operative time, as well as cost implications were analyzed.
Results: The ‘pre-COVID’ cohort included 390 patients, whilst the ‘during COVID’ group had 227. The rate of subtotal cholecystectomy was greater overall in the ‘during COVID’ group (1.03% vs. 3.08%). The rate of open conversion was higher in the ‘emergency during COVID’ group (7% vs. 7.94%). Operating times were longer overall in the ‘during COVID’ group, with the greatest difference seen in ‘emergency cases’ (median: 80 vs. 95 min). No difference in median length of stay (LoS) was seen in either ‘elective’ LC group, however the median LoS was longer for the ‘emergency during COVID’ group (5 vs. 6 days). A 43.25% reduction in elective LC operating was seen in the COVID-19 setting.
Conclusion: In conclusion, our study shows that the COVID-19 pandemic has had a negative impact on LC. This could be due to the delays seen in elective surgery during the pandemic and the increased likelihood of patients having prolonged complications of biliary disease, which consequently led to more complex cases encountered intra-operatively.
Hepato-biliairy & pancreas—gallbladder
O073—Surgical outcome of percutaneous transhepatic gallbladder drainage – 10 years’ experience from a tertiary care center
Szabolcs Abraham1, I. Tóth1, R. Benkő2, M. Matuz3, G. Kovács4, A. Nagy4, A. Paszt1, Z. Simonka1, A. Ottlakán1, G. Lázár1
University of Szeged, 1Department of Surgery, 2Central Pharmacy and Emergency Care Department, 3Department of Clinical Pharmacy, 4Radiology Department, Hungary
Aims: Percutaneous transhepatic gallbladder drainage (PTGBD) plays an important role in the treatment of elderly patients and/or patients in poor health status with acute cholecystitis (AC). The success of the intervention may be influenced by a number of factors such as the age of the patient, the performance status, and the level of gallbladder inflammation. The primary aim of this study is to find out how the abovementioned factors influence the clinical outcome of PTGBD. Moreover we assesed the timing and results of subsequent cholecystectomies.
Methods: We examined retrospectively the results of 162 patients undergoing PTGBD between 2010 and 2020 (male–female ratio: 51.23% vs. 48.77%; mean age: 71,43 ± 13.22 years). The patient’s performance status (American Society of Anesthesiologists (ASA score), Charlson comorbidity index (CCI)), the severity grade of AC (Tokyo Guidelines 2018/2013), and the outcomes of the intervention were assessed by technical (TSR) and clinical success rates (CSR) and in-hospital mortality. The conversion rate (CR) of possible urgent or delayed, elective laparoscopic cholecystectomies (LC) after PTGBD and the prevalence of biliary duct injury (BDI) were analyzed.
Results: PTGBD was definitive treatment in 47.53% of patients, while for the other patients it was bridging therapy prior to CCY. TSR was 97.53%, while CSR was 87.97%. The CSR was 86.27% above CCI 4 (CCI 0: 100%; CCI 1–3: 88.37%), while it was only 64.29% in grade III AC. In 9.87% of the cases, urgent LC was necessary after PTGBD, and its conversion rate was approximately equal to the conversion rate of elective LC (18.18 vs. 17.46%, respectively, p = 0.2217). There was no significant CR difference between elective LCs that were performed within 6 weeks after PTGBD and those performed later. Overall, the post-PTGBD in-hospital mortality was 11.72%, while in grade I AC it was 0%, while in grade II and III it were 7.41% and 40.91%, respectively. Based on logistic regression analyses, in-hospital mortality, clinical progression, and the need for emergency CCY were mostly determined by AC severity grade (OR: 6.07, CI: 1.79–20.56; OR: 7.62, CI: 2.64–22.05 and OR: 14.75, CI: 3.07–70.81, respectively).
Conclusion: PTGBD is an easy-to-perform intervention with promising clinical and technical success rate in the treatment of acute cholecystitis. It was used as a definitive therapy in half of the patients, while it served as bridging therapy for other patients before elective CCY. After PTGBD, the level of gallbladder inflammation had a decisive role in the course of AC. In a severe, grade III inflammation we have to calculate with low CSR and high mortality.
Hepato-biliairy & pancreas—gallbladder
O111—Surgeons compliance with an intraoperative time out to verify the critical view of safety in laparoscopic cholecystectomy
Pietro Mascagni1, 5, Marco Nizzardo1, T. Urade2, U.M.R. Rodríguez-Luna2, E. Felli3, P. Pessaux3, D. Mutter3, J. Marescaux2, G. Costamagna5, B. Dallemagne2, N. Padoy4
1IHU-Strasbourg, Institute of Image-Guided Surgery, Research, 2IRCAD, Research Institute Against Digestive Cancer, Research, 3Nouvel Hopital Civil Strasbourg, Digestive and Endocrine Surgery, 4Cube, University of Strasbourg, CNRS, IHU Strasbourg, Computer Science, France. 5Fondazione Policlinico Universitario A. Gemelli IRCCS, Digestive Surgical Endoscopy, Italy
Aims: As part of a quality improvement (QI) initiative to promote safe laparoscopic cholecystectomy (LC), surgeons were asked to describe the critical view of safety (CVS) to their assistant during a 5 s long time out before dividing the cystic duct (5 s rule). Aim of the present study is to evaluate surgeons’ compliance with the 5 s rule and intraoperative assessment of CVS criteria.
Methods: A medical student observed surgeons operating during a subset of the LC procedures included in the 5 s rule QI study. The observer recorded whether operating surgeons timed out to verify CVS and their assessment of CVS criteria. Surgeons were blinded to the observer evaluation. Postoperatively, 2 independent reviewers performed a video-based assessment (VBA) of CVS, defined as the clear view of 2 tubular structures connected to the gallbladder (C1), a well dissect hepatocystic triangle (C2) and lower part of the cystic plate (C3). Surgeons’ intraoperative assessment of CVS was compared with the mediated VBA of CVS.
Results: The intraoperative time out was performed in 33 of the 36 (91.67%) procedures shadowed by the observer. A decision to bailout was taken in 5 (13.89%; 3 fundus first and 2 subtotal cholecystectomies) procedures after discussing CVS principles. The mediated VBA found that CVS was achieved in 15 (48.39%) of the conventional LCs; the two video reviewers agreed on CVS assessment in 26 (83.87%) of the cases. Intraoperatively, operating surgeons stated that C1, C2 and C3 were achieved in 23 (74.19%), 21 (67.74%), and 16 (51.61%) of the conventional LCs, respectively. The intraoperative assessment agreed with the mediated VBA in 22 (78.57%), 13 (46.43%) and 19 (67.86%) of the cases for C1, C2 and C3 respectively.
Conclusion: Surgeons compliance with the 5 s rule QI intervention was optimal; however, surgeons’ intraoperative assessment of CVS was inconsistent, especially for what regards the evaluation of the hepatocystic triangle dissection.
Hepato-biliairy & pancreas—gallbladder
O248—Near-infrared fluorescence cholangiography assisted laparoscopic cholecystectomy: faster identification of relevant anatomy. Results of the Falcon RCT
Jacqueline van den Bos1, R.M. Schols1, E. Cassinotti2, T. Carus3, M.D.P. Luyer4, N. Warnaar5, A. Vahrmeijer6, F. Berrevoet7, J.F. Lange8, N.D. Bouvy1, L.P.S. Stassen1
1Maastricht University Medical Center, Department of Surgery, The Netherlands. 2Policlinico Hospital, Department of Surgery, Italy. 3Niels-Stensen-Kliniken, Department of Surgery, Germany. 4Catharina Hospital Eindhoven, Department of Surgery, The Netherlands. 5The Colchester IBD Centre, Department of Surgery, United Kingdom. 6Leiden UMC, Department of Surgery, The Netherlands. 7AZ Gent, Department of Surgery, Belgium. 8Erasmus MC, Department of Surgery, The Netherlands
Aims: to assess the potential added value of Near InfraRed Fluorescence (NIRF) imaging technique during laparoscopic cholecystectomy.
Methods: in this multicentre randomized controlled clinical trial, participants with an indication for elective laparoscopic cholecystectomy were included. The participating patients were randomised into a NIRF imaging assisted laparoscopic cholecystectomy (NIRF-LC) group and a conventional laparoscopic cholecystectomy (CLC) group. The primary end point was time to ‘Critical View of Safety’ (CVS). Secondary end points were ‘time to identification of the cystic duct (CD), the transition of the CD in the gallbladder and the transition of the cystic artery in the gallbladder, these all during dissection of CVS’; ‘total surgical time’; ‘intraoperative bile leakage from the gallbladder or cystic duct’; ‘bile duct injury’; ‘postoperative length of stay’, ‘complications due to the injected ICG’; ‘conversion to open cholecystectomy’; ‘postoperative complications (until 90 days postoperatively)’. These endpoints were all measured during surgery and/or in the 90 days following the procedure.
Results: 294 patients were included in this study, of which 143 were randomized in the NIRF-CL and 151 in the CLC group. The baseline characteristics did not differ between these two groups. The time to CVS was on average 19 min and 14 s for the NIRF-CL group and 23 min and 9 s for the CLC group (p-value 0.032). Time to identification of the CD was 6 min and 47 s and 13 min for NIRF-LC and CLC respectively (p-value 0.000). The transition of the CD in the gallbladder was identified after an average of 9 min and 39 s with NIRF-LC, compared to 18 min and 7 s with CLC (p-value 0.000). There was no difference in time needed to identify the cystic artery. The transition of the cystic artery in the gallbladder was identified after on average after 15 min and 6 s with NIRF-LC and 19 min and 35 s with CLC (p-value 0.011). There was no difference in postoperative hospital stay and postoperative complications. No complications due to the injected ICG were reported, apart form 1 patient who had a rash after injection of the dye.
Conclusion: The use of NIRF imaging in laparoscopic cholecystectomy provides earlier identification of relevant anatomy: earlier achievement of CVS, cystic duct visualisation and visualisation of both cystic duct and cystic artery transition into the gallbladder. No differences in complications or postoperative hospital stay were observed. It is unfortunately impossible in a RCT to accomplish reduction of the most dreaded complication of bile duct injury, but we believe that NIRF with its proven enhanced visualisation of anatomy offers a contribution to this prevention.
Hepato-biliairy & pancreas—liver
O013—“On-principle Pringle maneuver” versus “on-principle no-Pringle maneuver” in laparoscopic hepatectomies: a comparative analysis"
Panagiotis Lainas1, F Ratti2, H Tranchart1, F Cipriani2, I Dagher1, L Aldrighetti2
1Antoine-Beclere Hospital, Paris-Saclay University, Department of Minimally Invasive Digestive Surgery, France, 2IRCCS San Raffaele Hospital, Milan Hepatobiliary Surgery Division, Italy
Aims: The attitude towards Pringle maneuver varies among laparoscopic liver surgeons: some perform it “on principle” (OPPM), while others avoid it “on principle” (OPNPM). Primary aim of this study was to evaluate the effects of OPPM versus OPNPM on intraoperative and postoperative outcomes and rule out any negative effects of these techniques. Secondary endpoint was to analyse the effects of these approaches on selected patients at high risk for bleeding. Methods: Data from patients who underwent laparoscopic liver resection (LLR) in two tertiary European referral centres were collected in a prospective institutional database. Patients in OPPM and OPNPM groups were first compared to address the primary endpoint. Multivariate analysis was performed to screen factors associated with intraoperative blood loss. Results: 138 patients in OPNPM Group and 178 patients in OPPM Group were analyzed. Intraoperative blood loss and blood transfusion requirement were similar between groups. Conversion rate was 5.1% in the OPNPM Group and 6.7% in the OPPM Group. Twenty-five patients (18.1%) in the OPNPM and 26 patients (14.6%) in the OPPM centre had postoperative complications (p NS). Complex parenchymal sparing surgery, lesions located in postero-superior liver segments, lesion diameter > 5 cm and impaired liver parenchyma were found to significantly affect the risk of intraoperative bleeding. Use of Pringle maneuver did not protect from risk of bleeding at multivariate analysis. Pringle maneuver was found effective in protecting against intraoperative blood loss and need for blood transfusion in cirrhotic patients and those requiring complex parenchymal sparing procedures (non-anatomical resections). Conclusions: LLR can be safely performed using OPPM or OPNPM approaches. Indeed, as previously described regarding parenchymal transection techniques, the choice of intermittent hilar clamping can be based on surgeon and operating team preference. Nevertheless, a potential advantage of intermittent clamping for cirrhotic patients and non-anatomical resections was shown in our study.
Hepato-biliairy & pancreas—liver
O015—A systematic review and meta-analysis of randomized controlled trials comparing laparoscopic and open liver resection
Caelán Max Haney1, A. Studier-Fischer1, P. Probst1, C. Fan1, P.C. Müller2, M. Golriz1, M.K. Diener1, T. Hackert1, B.P. Müller-Stich1, A. Mehrabi1, F. Nickel1
1Heidelberg University Hospital. Department of General, Visceral, and Transplantation Surgery, Germany, 2University Hospital Zurich Department of Visceral and Transplant Surgery Switzerland
Background: The dissemination of laparoscopic liver resection (LLR) has been based on mainly non-randomized studies and reviews of these. Aim of the present study was to assess the current randomized evidence comparing LLR to open liver resection (OLR).
Methods: We performed a systematic review following Cochrane and PRISMA guidelines and AMSTAR-2 criteria. A systematic search for randomized controlled trials (RCT) comparing LLR to OLR for benign and malignant causes was performed over Medline, Web of Science, CENTRAL. The main outcome was postoperative complications. Certainty of evidence was assessed using the GRADE approach. The review was prospectively registered (reviewregistry866).
Results: We identified 13 RCTs totaling 1457 patients. Overall, there were significantly reduced odds of experiencing any complications (Odds ratio (OR) [95% confidence interval (CI)]: 0.42 [0.30, 0.58]) and severe complications (OR[CI]: 0.51 [0.31, 0.84]) for patients undergoing LLR compared to OLR. Furthermore, hospital stay was shorter (Mean difference (MD) [CI]: -2.90 days [-3.88, -1.92]), blood loss was lower (MD: [CI]:—115.41 ml [-146.08, -84.75]), and functional recovery was better for LLR. There were no differences in operating time, quality of life, R0 resection rate as well as overall survival and recurrence free survival for malignant disease. Overall certainty of evidence was medium to high. All trials assessed either minor liver resections or a mix of minor and major resections.
Conclusion: This review provides level 1 evidence of short-term benefits of LLR over OLR for minor liver resections. Further randomized evidence is needed on long-term outcomes and the role of laparoscopic major resection.
Hepato-biliairy & pancreas—liver
O016—Laparoscopic versus open hemihepatectomy: the ORANGE II PLUS multicenter randomized controlled trial
Robert S. Fichtinger1,12, Luca A. Aldrighetti2, Roberto I. Troisi3, Mohammed Abu Hilal4, Robert P. Suttcliffe5, Marc G.H. Besselink6, Somaiah Aroori7, Krishna V. Menon8, Bjørn E. Edwin9, Mathieu D'Hondt10, Valerio Lucidi11, Tom F. Ulmer12, Rafael Diaz-Nieto13, Zahir Soonawalla14, Steven White15, Gregory Sergeant16, Francesca Ratti2, Bram Olij1,16, Christoph Kümmerli4,17, Lloyd Brandts1, Siân A. Pugh4, Zina Eminton4,17, John N. Primrose4,17, Ronald M. Van Dam1,12,18, ORANGE II PLUS Collaborative
1Maastricht University Medical Center + , Maastricht, Netherlands2IRCCS San Raffaele Hospital, Milan, Italy 3. Ghent University Hospital, Ghent, Belgium 4. University Hospital Southampton NHS Foundation Trust, Southampton, United Kingdom 5. University Hospitals Birmingham NHS Foundation Trust, Birmingham, United Kingdom 6. Amsterdam University Medical Centers, University of Amsterdam, Amsterdam, Netherlands 7. University Hospitals Plymouth NHS Foundation Trust, Plymouth, United Kingdom 8. King’s College Hospital NHS Foundation Trust, London, United Kingdom 9. Oslo University Hospital, Oslo, Norway 10. Groeninge Hospital, Kortrijk, Belgium 11. Erasme Hospital, Brussels, Belgium 12. University Hospital RWTH Aachen, Germany 13. Aintree University Hospital NHS Foundation Trust, Liverpool, United Kingdom 14. Oxford University Hospital NHS Foundation Trust, Oxford, United Kingdom 15. Newcastle upon Tyne NHS Foundation Trust, Newcastle, United Kingdom 16. Jessa Hospital, Hasselt, Belgium 17. Southampton Clinical Trials Unit, Southampton, United Kingdom 18. GROW School for Oncology & Developmental Biology, Maastricht University, Maastricht, Netherlands
Introduction: Multimodal strategies to reduce physical impact and accelerate postoperative recovery have optimized and standardized perioperative care in liver surgery. The laparoscopic approach in major hepatectomy (LMH) is thought to reduce surgical impact to a patient and accelerate convalescence. Superiority of LMH to accelerate recovery compared to open major hepatectomy (OMH) is assessed in the randomized controlled trial we present in this abstract.
Methods: In 16 European liver surgery centers, patients undergoing hemihepatectomy for accepted indications were included in a trial with superiority design. All centers had an Enhanced Recovery program implemented.
Primary endpoint was time to functional recovery (TFR), defined as being independently mobile with adequate oral intake, oral pain relief, no intravenous fluids and normalizing liver function biochemistry. Secondary outcomes included length of hospital stay (LOS), postoperative 90-day morbidity and mortality, blood loss, operation time and 3-year survival in patients with malignancy.
To detect a 2-day reduction in TFR after LMH, with a 2-sided α = 0.04 and 80% power, a sample size of 350 patients was required. Linear, logistic and Cox unadjusted regression analyses were used to compare groups by intention-to-treat (ITT). Patients and ward personnel were blinded to the treatment intervention until postoperative day 4.
Results: 352 eligible patients were randomly assigned to LMH (n = 179) or OMH (n = 173), from October 2013 to January 2019. Excluding drop-outs, ITT-analysis included 327 patients (LMH n = 164 vs OMH n = 163). 277 patients had a malignancy, primarily CRLM (n = 162).
Hepato-biliairy & pancreas—liver
O017—Day-case surgery for minor laparoscopic liver surgery: a pertinent innovation?
Jean-Marc Regimbeau1, Jeanne Dembinski1, P. Léourier1, L. Rebibo2, R. Badaoui3, B. Brac1
1Amiens University Hospital, Department of digestive surgery, France, 2Bichat University Hospital, Department of digestive surgery, France, 3Amiens University Hospital, Department of anesthesiology, France
Background: Day-case surgery (DCS) and laparoscopic liver surgery (LLS) are booming. The aim of this study was to confirm the feasibility of LLS as DCS and to evaluate its implementation.
Methods: This was a prospective descriptive monocentric non-randomized study including all patients undergoing LLS (minor laparoscopic liver resection (LLR), cyst fenestration, radio-frequency ablation (RFA), between July 2015 and December 2018. Exclusion criteria were technique-related criteria, patient-related criteria, patient refusal, contraindication to DCS. The primary endpoint was success of ambulatory management. The secondary endpoints were compliance with the protocol, length of stay (LOS), complication rate. The evolution of the frequency of ambulatory LLR was studied.
Results: 265 patients underwent liver surgery, including 38 (14.3%) as DCS for LLR (22), RFA (7), association of LLR and RFA (1), or cyst fenestration (8). Twelve patients refused DCS. The DCS was successful for 29 patients (76.3%). Protocol was respected for 25 patients (65.8%). There were 9 unplanned admissions (23.7%), 2 unplanned consultations (5.3%), and 4 unplanned hospitalizations (10.5%). The LOS was 1.6 days for unplanned admissions and 1.8 days for unplanned hospitalizations. Complication rate was 7.9% (3 patients), reoperation rate 2.6% (1 patient). Ambulatory procedures increased initially, then decreased over time: 6.25% at the beginning, a maximum of 41.7%, and 18.2% in the end.
Conclusion: This study confirms the feasibility of LLS as DCS. Nevertheless, its implementation is low, with a high refusal rate. A short hospitalization (admission on the morning of the intervention and overnight hospitalization) may be an alternative in this case.
Hepato-biliairy & pancreas—liver
O018—Validation of a difficulty system for laparoscopic liver resection in a Spanish cohort
Carlos Redondo Cano, J. Mir Labrador, M. Cantos Pallarés, E. Artigues Sánchez de Rojas, R. Fabra Ramis, C. Zaragozá
University General Hospital of Valencia, General an Digestive Surgery Spain
Background: Minimally invasive liver surgery (MILS) has shown clear benefits when compared with conventional surgery; however is important to select the cases according to its difficulty and the surgeon’s experience and skills, The “difficulty scoring system” established at the 2º International Consensus Conference on LLR, Classify patients according to the predicted difficulty of the procedures, we investigated if this scoring system can predict the complexity of surgery and operative outcomes when applied to a cohort of patients who underwent MILS in our institution.
Methods: The data regarding patients undergoing MILS between 2007 and December 2020 were registered in a prospectively maintained database, four groups were performed according to the score on the difficulty classification; the intra and post-operative outcomes between groups were compared and statistically significant differences registered.
Results: 305 Laparoscopic Liver Resection were performed between June 2007 and December 2020, in a total of 263 patients, 60% males, mean age 62 years old (23–86). The main indication for liver resection were colorectal liver metastases in 159 cases (52%), median operative time and median blood loss were 240 min. (range: 55–690 min.) and 350 cc (range:0–2950 cc.) respectively, patients stayed in hospital a median of 4 days (range: 1–74 days) 98 (32%), 118 (39%), 64 (21%) and 25 (8%) cases were classified as low, intermediate, advanced and expert respectively. blood loss, operative time, LOS, and conversion rate showed a direct correlation with the difficulty level. The postoperative complications had no difference amongst groups.
Conclusion: The difficulty scoring system can be used to predict the intraoperative and postoperative outcomes before MILS. Thus, it is a valid tool to preoperatively estimate complexity of cases and select them accordingly to surgeon abilities.
Hepato-biliairy & pancreas—liver
O147—A scoring system to predict the risk of major complications after laparoscopic Liver resection in elderly patients with hepatocellular carcinoma
Boram Lee, J.Y. Cho, H.S. Han, H.W. Lee
Seoul National University Bundang Hospital, Department of Surgery, Korea
Background: The safety of laparoscopic liver resection (LLR) in elderly patients is a matter of concern because the reduced physiologic reserve increases the risk of major postoperative complications. However, there are few reports describing models for predicting major complications after LLR in elderly patients. This study aimed to investigate the clinical value of the Geriatric Nutritional Risk Index (GNRI) and propose a new simplified scoring system based on the GNRI to predict major complications after LLR in elderly patients with hepatocellular carcinoma (HCC).
Methods: We retrospectively reviewed 257 consecutive patients aged ≥ 65 years who underwent LLR for HCC between January 2004 and December 2019. The GNRI formula was 1.489 × serum albumin (g/L) + 41.7 × present weight/ideal weight (kg). Major complications were defined as complications of Clavien–Dindo grade III or higher.
Results: Major complications occurred after LLR in 24 patients (10.9%). Multivariable analysis showed that the GNRI (hazard ratio [HR] 3.396, 95% confidence interval [CI] 1.242–9.288, P = 0.017), Child–Pugh score (HR 2.191, 95% CI 1.400–8.999, P = 0.036), major liver resection (HR 2.683, 95% CI 1.082–7.328, P = 0.050) and intraoperative transfusion (HR 1.802, 95% CI 1.428–7.591, P = 0.022) were independent predictors of major postoperative complications. These variables were assigned points based on their HRs, and the resulting 10-point model showed good discrimination (area under the curve 0.756, 95% CI 0.649–0.836, P = 0.001).
Conclusions: The scoring system outperformed the GNRI for predicting major complications after LLR in elderly patients with HCC.

Hepato-biliairy & pancreas—liver
O148—The role of endoscopic ultrasound-guided transmural approach in management of biliary obstructions
Mateusz Jagielski, Michał Zieliński, J. Piątkowski, M. Jackowski
Collegium Medicum, Nicolaus Copernicus University, Department of General, Gastroenterological and Oncological Surgery, Poland
Aims: Transpapillary biliary drainage in endoscopic retrograde cholangiopancreatography is an established method for symptomatic treatment of patients with inoperable malignant biliary obstruction. Percutaneous transhepatic biliary drainage frequently remains the treatment of choice when the transpapillary approach proves ineffective. Recently, EUS-guided extra-anatomical anastomoses of bile ducts to the gastrointestinal tract have been reported as an alternative to percutaneous biliary drainage. To assess the usefulness of extra-anatomical intrahepatic biliary duct anastomoses to the gastrointestinal tract as endotherapy for inoperable malignant biliary obstruction and to determine factors affecting the efficacy of treatment.
Methods: A prospective analysis of the treatment results of all patients with inoperable biliary obstruction treated with endoscopic hepaticogastrostomy at our institution in the years 2016–2019.
Results: Transmural intrahepatic biliary drainage (endoscopic hepaticogastrostomy) was performed due to the ineffectiveness of ERCP in 53 patients (38 males, 15 females; mean age 74.66 [56–89] years) with inoperable biliary obstruction. Technical success of endoscopic hepaticogastrostomy was achieved in 52/53 (98.11%) patients. Complications of endoscopic treatment were observed in 10/53 (18.87%) patients. Clinical success of endoscopic hepaticogastrostomy was achieved in 46/53 (86.79%) patients. Bismuth type II–IV cholangiocarcinoma, hepatic metastases, ascites, suppurative cholangitis, and high blood bilirubin levels exceeding 30 mg/dL were independent factors for increased complications and inefficacy of endoscopic hepaticogastrostomy.
Conclusions: In the event of transpapillary biliary drainage proving ineffective, extra-anatomical anastomoses of bile ducts to the gastrointestinal tract provide an effective method for the treatment of patients with malignant biliary obstruction.
Hepato-biliairy & pancreas—liver
O149—Benefits of laparoscopic approach for major hepatectomy in cirrhotic patients. Time for pushing indications beyond the limits? A PSM study
Andrea Benedetti Cacciaguerra1, M. Abu Hilal2
1Fondazione Poliambulanza, Department of Surgery, 2Fondazione Poliambulanza Brescia, HPB and Minimally invasive surgery, Italy
Background: Although the value of laparoscopic liver resection to treat malignancies cirrhotic patients has been increased, clear evidence on its advantages during extended liver resection are still lacking. The aim of present study is to compare the outcome of major laparoscopic liver resection (mjLLR) vs major open liver resection (mjOLR) in cirrhotic patients.
Methods: A cohort study of cirrhotic patients, who underwent mjOLR and mjLLR in fourteen international referral centres between 2000 and 2019, was performed. A comparative analysis, based on selected preoperative and intraoperative variables, was performed after implementation of propensity score matching (PSM) on both surgical approaches (mjLLR and mjOLR) and on study subgroups. Finally, Kaplan Meier method was used to assess long-term outcome in cirrhotic patients with HCC.
Results: In total 390 patients were identified. After PSM 97 patients were selected in both groups. In the mjLLR group less blood loss (p = 0.015), lower rate of total and severe complication (p = 0.001, 0.007), such as surgical site infection, AKI and liver failure were observed. Moreover, after mjLLR hospital stay was shorter than that of mjOLR (p = < 0.001). Blood loss was significantly lower only during major laparoscopic right hepatectomy, (p = < 0.001), while incidence of severe complication and shorter hospital stay was observed only after major laparoscopic left hepatectomy, (p = 0.041, < 0.001). No difference was found in terms of overall survival and disease free survival between mjLLR and mjOLR for HCC.
Conclusion: This study shows advantages of mjLLR for improving postoperative outcome of cirrhotic patients compared to mjOLR, without compromising the long-term outcome. These findings might have a great value for liver surgeons and hepatologist in the era of multimodal management of oncologic liver disease (Table 2.
Table 2.
Perioperative and postoperative outcomes of patients undergoing laparoscopic and open major liver resections in cirrhoticpatients, before and after propensity score matching


Hepato-biliairy & pancreas—liver
O150—Long-term outcomes of laparoscopic liver resection for centrally located hepatocellular carcinoma
Hyo Jun Kim, J.Y. Cho, H.S. Han, Y.S. Yoon, H.W. Lee, J.S. Lee, B.R. Lee, J.Y. Kim
Seoul National University Bundang Hospital, Department of Surgery, Korea
Aims: Laparoscopic liver resection is currently becoming standard treatment option for Hepatocellular Carcinoma (HCC). However, despite technical advancement, the feasibility of LLR for centrally located tumors is still controversial since they are usually located close to the liver hilum, major hepatic veins, or inferior vena cava (IVC). This study aims to evaluate the feasibility and safety of LLR for centrally located tumors and compare perioperative outcomes with the open liver resection (OLR).
Methods: We retrospectively reviewed the medical records of 634 patients who underwent LLR for HCC between January 2004 to September 2018 in our center. Among them, 56 patients with centrally located tumors were retrospectively analyzed. The perioperative outcomes of these patients were compared with 51 patients who underwent OLR with similar location during the same period. In order to analyze the effect of recent advancement of LLR techniques, we divided LLR group into two subgroups according to the date of operation: Group1 (n = 18) and Group2 (n = 38) who underwent LLR before and after 2015.
Results: Majority of the patients underwent segmentectomy (50.0%), followed by right hemihepatectomy (10.7%) and right anterior sectionectomy (8.9%). There was no mortality within 3 months. Compared with OLR group, operation time (285 vs 280 min, P = 0.920) and postoperative complication rate (21.4 vs 27.5%, P = 0.468) were not significantly different. However, intraoperative blood loss (490 vs 700 ml, P < 0.001), transfusion rate (10.7 vs 31.4%, P = 0.008), and hospital stay (6 vs 10 days, P < 0.001) were significantly lower in the LLR group. There were no statistically significant differences in overall survival rates and disease-free survival rates between two groups. In LLR group, Group2 showed shorter hospital stay (6 vs 8 days, P < 0.001) compared with Group1. Although statistically not significant, there were improvements in the operation time (278 vs 345 min, P = 0.05) and less intraoperative blood loss (415 vs 500 ml, P = 0.065) in Group2.
Conclusions: In this study, we demonstrated that LLR can be safely performed in selected patients with centrally located HCC.
Hepato-biliairy & pancreas—liver
O151—Benefits of laparoscopic major hepatectomy in cirrhotic patients. Time for pushing indications beyond the limits? A propensity score matching
Andrea Benedetti Cacciaguerra
Spain
Background: Despite an increasing use of the laparoscopic approach for liver resection in cirrhotic patients, clear evidence of its advantage on open approach during major liver resection is still lacking. The aim of this study is to compare the outcome of major laparoscopic liver resection (mjLLR) vs major open liver resection (mjOLR) in cirrhotic patients.
Methods: Cirrhotic patients undergoing major liver resection in fourteen HPB centers between 2000 and 2019 were classified, according to surgical approach, in mjLLR and mjOLR patients. A comparison of clinical, demographic, and perioperative data of mjLLR and mjOLR patients was performed in the overall study group and after propensity score matching (PSM). Additionally, long-term outcomes of patients resected for HCC were compared between mjLLR and mjOLR patients.
Results: Overall study group included 390 patients, 112 undergoing mjLLR and 278 mjOLR. After PSM, 97 patients were selected in each group. In the mjLLR group, compared to mjOLR, less blood loss (p = 0.015), lower rate of total and severe complication (p = < 0.001, 0.007), such as surgical site infection, AKI and liver failure were observed, parallel to a shorter length of hospital stay (p = < 0.001). Stratification of patients according to hepatectomy side, right (RH) versus left hepatectomy (LH) showed lower intraoperative blood loss during laparoscopic RH, compared to open RH (p = < 0.001), while incidence of severe complication and shorter hospital stay was observed only after laparoscopic LH, (p = 0.041, = < 0.001). Subgroup analysis of long term survival following HCC resection showed no difference between mjLLR and mjOLR.
Conclusion: This study shows benefits of mjLLR for improving postoperative outcome of cirrhotic patients compared to mjOLR, without compromising the long-term outcome. These findings might have a great value for liver surgeons and hepatologist in the era of multimodal management of oncologic liver disease.
Hepato-biliairy & pancreas—Liver
O191—Radiofrequency ablation versus surgical resection in elderly patients with hepatocellular carcinoma in Milan criteria
Maria Conticchio1, A Delvecchio1, F. Ratti2, M. Gelli3, F.M. Anelli4, A. Laurent5, G.C. Vitali6, P Magistri7, G. Assirati7, E Felli8, T Wakabayashi8, P. Pessaux8, T. Piardi9, F. Di Benedetto7, N. de' Angelis5, J.F.B. Delgado10, A.G. Rampoli11, R. Adam12, D. Cherqui12, L. Aldrighetti2, R. Memeo13
1Università degli studi di Bari-Policlinico di Bari, Department of Emergency and Organ Transplantation, University “Aldo Moro” of Bari, Italy. 2Hepatobiliary Surgery, San Raffaele Hospital, Milan, Italy. 3Département de Chirurgie Viscérale, Gustave Roussy Cancer Campus Grand Paris, Villejuif, France. 4Unit of Oncologic and Pancreatic Surgery, Hospital University Reina Sofía, Córdoba, Spain. 5Assistance Publique—Hôpitaux de Paris (AP-HP), Department of Digestive and Hepatobiliary Surgery, Centre hospitalier universit, France. 6Service of Abdominal Surgery, Geneva University Hospitals and Medical School, Geneva, Switzerland. 7Hepato-Pancreato-Biliary Surgery and Liver Transplantation Unit, University of Modena and Reggio Emilia, Modena, Italy. 8Institut de Recherche contre les Cancers de l'Appareil Digestif (IRCAD), Strasbourg, France. 9Department of Surgery, Hôpital Robert Debré, Reims, France, Department of Surgery, France. 10Unit of Oncologic and Pancreatic Surgery, Hospital University Reina Sofía, Córdoba, Spain. 11Interventional Radiology Unit, Niguarda Hospital, Milan, Italy. 12Department of Surgery, Centre Hépatobiliaire, Hôpital Paul Brousse, Villejuif, France. 13Division of Hepato-Pancreato-Biliary Surgery, "F. Miulli" General Hospital, Acquaviva delle Fonti, Bari, Italy
AIMS Our work was the evaluation of short and long term outcome in elderly patients(> 70 years)with hepatocellular carcinoma(HCC)in Milan criteria, which underwent liver resection(LR)or radiofrequency ablation (RFA).METHODS The study included 594 patients with HCC in Milan criteria(429 in the LR group and 165 in the RFA group)managed in 10 European centers.Statystical analysis was performed using the Kaplan–Meier method before and after propensity score matching(PSM)and Cox regression.RESULTS After PSM,we compared 136 patients in the LR group with 136 patients in the RFA group.OS at 1,3,and 5 years was 91, 80,and 76% in the LR group and 97,67,and41% in the RFA group respectively(p = 0.001).DFS at 1,3,and 5 years was 84,60and 44% for the LR group, and 63,36,and 25% for the RFA group(p = 0.001).Postoperative Clavien-Dindo III-IV complications were lower in the RFA group(1vs11%, p = 0.001)in association with a shorter length of stay(2vs7 days, p = 0.001).In multivariate analysis,MELD score(> 10) (OR = 1.89),increased value of International Normalized Ratio/INR (sec > 1.3)(OR = 1.60),treatment with radiofrequency(OR = 1.46),and multiple nodules (OR = 1.19)were independent predictors of a poor overall survival while a high MELD score(> 10)(OR = 1.51)and radiofrequency(OR = 1.37)were independent factors associated with a higher recurrence rate.CONCLUSIONS Despite a longer length of stay and a higher rate of severe postoperative complications,surgery provided better results in long-term oncological outcomes as compared to ablation in elderly patients(> 70 years)with HCC in Milan criteria.
Hepato-biliairy & pancreas—pancreas
O103—Tri-staple vs ultrasonic scalpel in distal pancreatectomy (TRUDY). A randomized controlled, multicenter, patient blinded, superiority trial
Matteo De Pastena1, L. Landoni1, G. Malleo1, S. Paiella1, M. Ramera1, M. Fontana1, A. Borin1, A. Esposito1, R. Salvia1, G. Butturini2, C. Bassi1
1University of Verona, General and Pancreatic Surgery, 2Ospedale Pederzoli Peschiera del Garda, Pancreatic Surgery, Italy
Background: Several systematic reviews have investigated pancreatic stump management to reduce the postoperative pancreatic fistula (POPF) rate. The study aimed to evaluate if the parenchymal transection using the triple-row reinforced stapler decreases the incidence of POPF compared with ultrasonic transection after distal pancreatectomy (DP).
Methods: a bicentric, phase 3, patient-blinded, randomized clinical trial was conducted. All patients. submitted to elective DP from July 2018 through July 2020 were screened. Exclusion criteria were an extended resection, gastrointestinal resections or anastomoses, and a pancreatic thickness > 17 mm measured at the point of parenchymal transection. The experimental group received the Endo GIA Reinforced Reload with Tri-Staple Technology® (TS), while the control group the Harmonic Focus® (US).
Results: A total of 152 patients undergoing DP met the inclusion criteria and were randomized. Due to a positive transection margin on frozen section analysis requiring further resection, seven patients were excluded post-randomization. Therefore, the final population comprised 72 patients in the TS arm and 73 patients in the US arm. Overall, 23 patients (16%) developed POPF. There were 19 grade B (14%) and 4 grade C fistulas (2%). The incidence of POPF was similar between groups (TS 12% vs. US 19%, p = 0.191).
Conclusion: the present randomized controlled trial of stapled transection using a PGA-reinforced triple-row stapler versus ultrasonic transection with HARMONIC® energy devices in elective DP demonstrated no significant difference in POPF rates.
Hepato-biliairy & pancreas—pancreas
O105—Development and validation of a suture training model for open, laparoscopic and robotic pancreatic surgery
Emir Karadza, C.M. Haney, E.F. Limen, K.F. Kowalewski, M. Sandini, E. Wennberg, M.W. Schmidt, E.A. Felinska, F. Lang, H.G. Kenngott, T. Hackert, B.P. Müller-Stich, F. Nickel
Heidelberg University Hospital, Depatment of General, Visceral and Transplantation Surgery, Germany
Introduction: Due to the fragile nature of pancreatic tissue and the small pancreatic duct lumen, performing pancreaticojejunostomy in pancreatoduodenectomy is demanding and requires adequate training to ensure low complication rates. Especially in minimally invasive and robotic surgery the pancreatic anastomosis should be trained outside the operating room before performing on patients. Realistic training models with adaptive tissue properties were therefore developed for pancreatico-, gastro- and hepaticojejunostomy with pancreas, small bowel, stomach, bile duct and a training torso (Fig. 1).
Methods: The pancreas models were produced with different silicone mixtures and additives, using 3D-printed molds generated out of segmented computed tomography data. Pancreatic remnant with soft and hard texture and small and large duct were incrementally developed, evaluated, and compared to commercially available models. Two-layered models for small bowel and stomach, and single layered bile ducts were developed. Highly experienced pancreatic surgeons evaluated the different models using the evaluation criteria of haptic realism, rigidity, fragility of tissue and duct, as well as the realism of suture behavior. Likert scales and qualitative analysis were used.
Results: The initial evaluation showed moderate to high haptic realism and superiority of all four of the developed soft pancreas models (Likert scale score 1 to 5 where 5 represents high realism compared to human tissue) over the commercially available model (means: 3.3 ± 0.8, 3.5 ± 1.6, 3.9 ± 1.6, 3.2 ± 1.6 vs. 1.8 ± 1.4; p-values: p1 = 0.039, p2 = 0.008, p3 = 0.002, p4 = 0.039). The hard pancreas models were rated moderate to high in haptic realism (means: 3.9 ± 0.9, 2.8 ± 1, 2,7 ± 1.4, 3.3 ± 1.2) and moderate to highly realistic in suture behavior (means: 3.9 ± 1.2, 3.2 ± 1.3, 3.4 ± 1.5, 4.5 ± 0.5). The commercial hard pancreas model performed equal to the developed models in both categories (mean haptic realism: 3.3 ± 1.4; mean realism in suture behavior: 3.5 ± 1.7). In the incremental development process the pancreas models were modified by adding a pancreatic capsule, which resulted in high haptic realism (mean soft pancreas: 4.6 ± 0.7) and highest realism in suturing (mean soft pancreas: 4.9 ± 0.5). After initial evaluations the small bowel and the stomach models were modified in wall thickness and tissue properties. The modifications of small bowel and stomach resulted in higher haptic realism (small bowel means: 4.8 ± 0.4 vs. 3.1 ± 1.2, p < 0.0001), optimal wall thickness (Likert scale from -2 to + 2 where 0 represents the optimum; Small bowel means: 0.2 ± 0.7 vs. -0.8 ± 0.9, p = 0.007) and optimal suture behavior (small bowel means: 0.1 ± 0.5 vs. 1.4 ± 0.8, p = 0.0001). Evaluations of the soft and hard bile duct models showed optimal wall thickness (means: 0.3 ± 0.6 and 0.4 ± 0.6) and optimal tissue fragility (means: -0.3 ± 0.7 and 0.1 ± 0.6).
Discussion: Overall, by the end of the evaluation process the models showed very high realism in all evaluation criteria. The modifications of the different organ models improved haptic realism and suture behavior. The models showed very high realism compared to human tissue and are therefore highly suitable for realistic surgical training (Fig. 2). They are now implemented in the surgical training routine and used for translational research to show surgeons and patients benefits.


Hepato-biliairy & pancreas—pancreas
O106—401 consecutive minimally invasive distal pancreatectomies: lessons learned in 20 years’ experience
Marco Ramera1, Giovanni Butturini1, A. Esposito2, M. De Pastena2, .L Landoni2, A. Giardino1, C. Bassi2, R. Salvia2, G. Butturini1
1Pederzoli Hospital, Unit of General and Pancreatic Surgery, 2University of Verona Hospital Trust, Unit of General and Pancreatic Surgery, Italy
Background and Objectives: The study aimed to discuss and report the trend, outcomes and learning curve effect after minimally invasive distal pancreatectomy (MIDP) at two high-volume centers.
Methods: Patients undergoing MIDP between January 1999 and December 2018 were retrospectively identified from prospectively maintained electronic databases. The entire cohort was divided into two groups, constituting the “early” and the “recent” phase. The learning curve effect was analyzed for laparoscopic (LDP) and robotic distal pancreatectomy (RDP). The follow up was at least two year.
Results: The study population included 401 consecutive patients (LDP n = 300, RDP n = 101). Twelve surgeons performed MIDP during the study period. Although patients were more carefully selected in the early phase, in terms of median age (49 vs. 55 years, p = 0.026), ASA class lower than 3 (9% vs. 3%, p = 0.018), previous abdominal surgery (10% vs. 34%, p < 0.001), and pancreatic adenocarcinoma (PDAC) (7% vs. 15%, p = 0.017), the recent phase has shown similar perioperative outcomes. Differently from RDP, the increase of experience in LDP was inversely associated with the operative time (240 vs 210 min, p < 0.001), morbidity rate (56.5% vs. 40.1%, p = 0.005), intra-abdominal collections (28.3% vs. 17.3%, p = 0.023), and length of stay (8 vs. 7 days, p = 0.009). As compared to distal pancreatectomy with splenectomy for other pathology, resections for PDAC (n = 45) showed an increased operating time (285 vs 245 min, p = 0.010), conversion rate (20% vs 8.9%, p = 0.027) and chyle leak (6.7% vs 0.4%, p = 0.012). After a median follow-up of 31 (IQR 25.5–53) months, patients affected by PDAC showed an estimated median survival of 53 months (95% CI [29–77]) and a 1-year and 3-year survival rate of 96% and 71% respectively. Interestingly, three patients developed abdominal wall recurrence.
Conclusion: In the setting of high-volume centers, the surgical training of MIDP is associated with acceptable rates of morbidity. The learning curve can be largely achieved by several team members, improving the outcomes over time. These results require surgeons with senior status and extensive experience to be available to act as proctors. Moreover, with an adequate patient selection, MIDP for PDAC offers good oncological outcomes.


Hepato-biliairy & pancreas—pancreas
O107—Implementation and training with laparoscopic distal pancreatectomy: 23-year experience from a high-volume center
Mushegh Sahakyan1, B. Røsok2, T. Tholfsen2, D. Kleive2, A. Waage2, D. Ignjatovic2, T. Buanes2, K.J. Labori2, B. Edwin2
Oslo University Hospital, Rikshospitalet, 1The Intervention Center, 2Department of HPB Surgery, Norway
Background: Distal pancreatectomy is the most common procedure in minimally-invasive pancreatic surgery. Data in the literature suggest that its learning curve flattens after performing up to 30 procedures. However, the exact number remains unclear.
Methods: The implementation and training with laparoscopic distal pancreatectomy (LDP) in a high-volume center between 1997 and 2020 were studied. Perioperative outcomes and factors related to conversion were assessed. The individual experiences of four different surgeons (pioneer and adopters) performing LDP on a regular basis were examined (Fig. 1).
Results: Six hundred forty LDPs were done accounting for 95% of all distal pancreatectomies performed throughout the study period (Fig. 2). Conversion was needed in 14 (2.2%) patients due to intraoperative bleeding or tumor adherence to the major vasculature. Overall morbidity and mortality rates were 35 and 0.6%, respectively. Intra- and postoperative outcomes did not change for any of the surgeons within their first 40 cases. Furthermore, 9 of 14 conversions reported occurred when surgeons had already surpassed the experience with the first 40 cases. Analysis of the first 40 procedures performed by the adopters demonstrated steady decrease of senior surgeon assistance/supervision without compromising the intra- and postoperative outcomes. Operative time significantly decreased after the first 80 cases for the pioneer surgeon and did not change afterwards regardless of significant increase in the proportion of ductal adenocarcinoma. Tumor size increased after the first 80 cases for the first adopter without affecting the operative time.
Conclusion: In this nearly unselected cohort, no significant changes in surgical outcomes were observed throughout the first 40 LDPs for different surgeons. The exact number of procedures required to overcome the learning curve is difficult to determine as it seems to depend on patient selection policy and specifics of surgical training at the corresponding center.
Hepato-biliairy & pancreas—pancreas
O108—Assessment of difficulty in laparoscopic distal pancreatectomy: a modification of the Japanese difficulty scoring system
Giacomo Deiro, M De Pastena, S Paiella, A Balduzzi, E Bannone, G Montagnini, E Andreotti, C Filippini, M Ramera, A Esposito, R Salvia
University of Verona, General and Pancreatic Surgery, Italy
Background: The Japanese difficulty scoring system (DSS) was developed to assess the difficulty of laparoscopic distal pancreatectomy (LDP). The study aimed to create and validate a modified DSS (mDSS) in a European high-volume center.
Methods: Patients' clinical data underwent LDP for benign and malignant pancreatic lesion between September 2013 and February 2020 were reviewed. Expert laparoscopic surgeons performed the procedures. In addition to the five parameters of the DSS, neoadjuvant therapy was added to create the mDSS. Surrogates of case complexity (operative time, intraoperative blood loss and blood transfusion requirements, conversion rate) were used to validate the new scoring system. According to the difficulty level, the mDSS was subdivided into three classes, low, intermediate, and high.
Results: The study population included 140 LDP. Ninety-eight (70%), 32 (23%) and 10 (7%) patients belonged to low, intermediate, and high difficulty groups. The new mDSS identified the complexity of the surgical case of the series perfectly for all the surrogates of complexity considered, namely conversion rate (p = 0.004), operative time (p = 0.033), intraoperative blood loss (p = 0.009), and intraoperative transfusions (p = 0.033).
Conclusion: The mDSS for LDP stratified the pancreatic procedures perfectly according to their complexity. The new scoring system seems to be a safe option to introduce to the LDP's stepwise learning approach even in Western Countries.
Hernia-adhesions—abdominal wall hernia
O058—Minimally invasive repair for lateral ventral hernia: tailored approach from a hernia centre at a tertiary care institution
Sajid Malik, D. Lomanto, S. Wijerathane
National University Hospital, Minimally Invasive Surgery, Singapore
Introduction: Lateral ventral hernia (LVH) is rare and can be primary or secondary. Surgical treatment of this rare hernia type is challenging due the anatomic location and technical challenges in placement and secure anchoring of mesh.
Method: Patient demographic data, intra-operative data and post-operative outcomes on all LVH repairs performed with endo-laparoscopic and robotic approach between 2016 to 2018 were reviewed and analysed.
Results: 22 LVH were repaired in 21 patients. 9 had primary hernia and 13 had secondary hernia. All patients underwent minimally invasive surgery (MIS) for hernia repair with no conversion to open surgery. Fascial defect closure and placement of mesh were performed in all cases. Different approaches were utilized: 9 hernia repaired with laparoscopic intraperitoneal on-lay mesh technique with defect closure (IPOM +), 4 had laparoscopic trans-abdominal pre-peritoneal repair (TAPP), another 4 had extended totally extra-peritoneal repair (eTEP), 3 had robotic TAPP (rTAPP) and 2 repaired with trans-abdominal partial extra-peritoneal (TAPE) approach. 4 (19%) of the patients developed post-operative seroma which were managed conservatively. No other significant complication was noted, and no chronic pain or recurrence reported within a minimum follow-up of 12 months.
Conclusion: This case series gives a broad outline of possible MIS options available for LVH repair and recommendations for a tailored approach. The surgical technique needs to be individualized according to the size and anatomic location of the defect, other intra-operative findings and patient characteristics.
Hernia-adhesions—abdominal wall hernia
O059—Hybrid operation technique for incisional hernia repair, a systematic review and meta-analysis of intra- and postoperative complications
Matthijs Van den Dop1, G.H.J. De Smet1, G.J. Kleinrensink2, W.E. Hueting3, J.F. Lange1
Erasmus University Medical Centre, 1Surgery, 2Neuroscience, 3Alrijne hospital, Surgery, The Netherlands
Background: Incisional hernia (IH) occurs approximately in 15% of patients after midline surgery. Surgical treatment for IHs include a solely open or solely laparoscopic approach with mesh placement. Recently, hybrid (combined laparoendoscopic and open) approaches are being performed. This systematic review evaluates the perioperative complications of hybrid incisional hernia repair (HIHR).
Methods: EMBASE, Medline via OvidSP, Web of Science, Cochrane and Google Scholar databases were searched. Studies providing data on intra- and postoperative complications in patients that underwent hybrid procedure for IH repair were included. Data on intra- and postoperative complications were extracted and a meta-analysis was performed. Study quality was assessed with the Newcastle Ottowa Scale, ROBINS-I tool, and Cochrane risk of bias. PROPERO registration: CRD42020175053.
Results: Nine studies (n = 1596 patients) were included. Five studies compared intra-operative complications between HIHR and laparoscopic incisional hernia repair (LIHR) with a pooled incidence of 1.8% in HIHR group and 2.8% in LIHR group (p = 0.13). Comparison of postoperative prevalence of surgical site occurrences (SSOs) (24% versus 31%, p = 0.02) and surgical site occurrences requiring interventions (SSOPIs) (1.5% versus 4.1%, p < 0.01) were in favour of the HIHR group (Figs. 1 and 2). Overall postoperative complications seemed to occur more frequent in the LIHR group, though no hard statements could be made due to the vast heterogeneity in reporting between studies.
Conclusion: Although the majority of studies were retrospective and included a small number of patients, HIHR led to less SSOs and SSOPIs compared to LIHR. This systematic review forms a strong invitation for more RCTs to confirm the benefits of this approach.


Hernia-adhesions—abdominal wall hernia
O060—Laparoscopic totally extra-peritoneal repair of ventral hernia and incisional hernia using Rives Stoppa principles: first 100 cases experience
Eliyahu Gorgov1, S. Rayman2, M. Molham2, A. Keidar2, Y. Mnouskin2
1Samson Assuta Hospital, Faculty of science, Ben-Gurion University of the Negev, Israel, Department of general surgery, 2Asuta Ashdod, General Surgery, Israel
Aim: To present our experience with the technique and the shorts and long term results of first 100 patients using laparoscopic eTEP Rives-Stoppa hernia repair.
The newly described technique of laparoscopic repair of ventral and incisional hernia combining the rives stoppa principle of retro-muscular repair and using the eTEP(enhanced view totally extraperitoneal repair) principles first described by Jorje Daes for inguinal hernia in order to address ventral and incisional hernia with mesh placement after reconstruction of functional anatomy of abdominal wall.
Methods: Retrospectively collected data. The series includes 107 patients (37 male /70 female) operated in a single center by single surgeon, which underwent laparoscopic "Rives-Stoppa" hernia repair. All patient were operate, between 8/2017–11/2020.
Patient demographics, hernia characteristics, operative details, perioperative complications, and quality of life outcomes utilizing a modified and adjusted scale were included in our data analysis.
Results: In our study the mean age was 61.5 (32–88), and average BMI 31 (22.1–46.1), mean ASA score 2.5 (1–4). 80 patients with post-operative incisional hernia and 27 with primary hernia ± diastasis recti. 25 patients had laparoscopic TAR (5 bilateral, 20 unilateral of which 4 left and 16 right). Hernia size ranged from 0.5 up to 18 Cm in diameter.
Average operative time 153 min (65–324) with no intra-operative complecations,87 patients had unremarkable post-operative curse, 10 patients had developed seroma (of which 2 patients had to undergo drainage), 3 suffers from infection at surgical site(without infection of surgical mesh), 3 patents suffered from paralytic ileus, 3 patients had reoperations 2 due to separation of posterior fascia and entrapment of small bowl and one due to peritonitis in POD 9 in operation necrosis of right colon (presumed ischemic colitis/thermal injury).
LOS (length of hospital stay) was 2.5 days 3 patients had recurrence (ranging from several days postoperative and up to 4 months post operation).
Conclusions: Laparoscopic Rives-Stoppa hernia repair is a new method for repair of ventral hernia and needs to be further evaluated in prospective control trials.
Hernia-adhesions—abdominal wall hernia
O062—A new three-step hybrid approach is a safe procedure for incisional hernia: early experiences with a single centre retrospective cohort
Matthijs van den Dop1, G.H.J. De Smet1, M.P.A. Bus2, J.F. Lange1, S.M.P. Koch2, W.E. Hueting2
1Erasmus University Medical Centre, Surgery, 2Alrijne hospital, Surgery, The Netherlands
Purpose: In this study, a three-step novel surgical technique was developed for incisional hernia, in which a laparoscopic procedure with a mini-laparotomy is combined: so-called ‘three-step incisional hybrid repair’. The aim of this study was to reduce the risk of intestinal lacerations during adhesiolysis and recurrence rate by better symmetrical overlap placement of the mesh.
Objectives: To evaluate first perioperative outcomes with this technique.
Methods: From 2016 to 2020, 70 patients (65.7% female) with an incisional hernia of > 2 and < 10 cm underwent a elective three-step incisional hybrid repair in two non-academic hospitals performed by two surgeons specialized in abdominal wall surgery (Fig. 1). Intra- and postoperative complications, operation time, hospitalization time, and hernia recurrence were assessed.
Results: Mean operation time was 100 min. Mean hernia size was 4.8 cm; 45 patients (64.3%) had a hernia of 1- 5 cm, 25 patients (35.7%) of 6-10 cm. Eight patients had a grade 1 complication (11.4%), five patients a grade 2 (7.1%), two patients (2.8%) a grade 4 complication, and one patient (1.4%) a grade 5 complication. Five patients had an intra-operative complication (7.0%), two enterotomies, one serosa injury, one omentum bleeding, and one laceration of an epigastric vessel. Mean length of stay was 3.3 days. Four patients (5.6%) developed a hernia recurrence during a mean follow-up of 19.5 weeks.
Conclusion: A three-step hybrid incisional hernia repair is a safe alternative for incisional hernia repair. Intra- operative complications rate was low.

Hernia-adhesions—abdominal wall hernia
O063—Abdominal wall restored. Post-pregnancy project
Osvaldo Santilli, H. Santilli, N. Nardelli, H. Etchepare, R. Scaravonati
Centro de Patología Herniaria Argentina, Cirugía, Argentina
Aims: The objective is to summarize our knowledge on diastasis rectus abdominis (DRA) based on the experience collected in the Abdomen Project (AP); An interdisciplinary program that aims to restore the anatomical and functional structure of the abdominal wall after the degenerative process that could cause pregnancy.
Method: Retrospective analysis of a prospective database. We used a multidisciplinary evaluation and included:
The abdominal wall surgeon started the assessment to identify in Valsalva maneuver, zone of weakness along the midline, visible bulge, or hernia protrusions. A minimally invasive endoscopic technique has been using to correct the degeneration process.
Physiotherapist evaluated an abdominal wall dysfunction with the “Core Muscle Endurance Test of Stuart McGill” and performed treatment focused on the degeneration area and guided the sports rehabilitation protocol.
The Radiologist used ultrasonography (US) and Computed Tomography (CT) scan. The Aesthetic surgeon evaluated the patient skin flaps and any need for dermolipectomy.
According to the findings, we propose a classification.
Results: In the period January 2017 to June 2019, 1085 patients were evaluated and concluded the proposal treatment, The clinical entities for consultation were: 911 aesthetic discomfort (84%), 152 abdominal lump (14%), and 22 pain in Linea Alba (2%). The proposal classification and treatment considered: Grade I: 760 patients (70%); Grade II: 248 patients. (64%) performed physiotherapy, with associated surgical treatment being necessary in 94 patients (38%); Grade III: 77 patients (7%) underwent surgery as the first treatment in addition to physiotherapy plan. We performed 171 surgical treatments and 56 patients require dermolipectomy. All patients were treated on an outpatient basis. Postoperative complication were recorded: 31 (14%) seromas, 11 (5%) omphalitis and 5 (2%) hematomas since 1 (0.44%) required surgical dressing. Mc Gill and Us Check up post-treatment test showed improvement in 77% of patients.
Conclusion: The evaluation and treatment of DRA in post-pregnant using a multidisciplinary approach concept showed good initial results. To our knowledge.
Hernia-adhesions—abdominal wall hernia
O064—Slim-Mesh: 11-year follow-up study on long-term results in 80 cases comprising 26 with large-giant/massive ventral hernia
Silvio Alen Canton, A. Piotto, C. Pasquali
Padova University, Department of Surgery, Oncology and Gastroenterology, Italy
Aims: We have analysed the long-term (l.t.) results of the “Slim-Mesh” (SM) technique for ventral hernia (VH) repair with an 11-year follow-up (f.u.) study.
Methods: From September 2009 to December 2018, 80 patients with VH were operated on with the SM technique at our Department. This was a prospective (59%)-retrospective study. Technical trick: during the 4th phase of the procedure, the surgeon superimposes the SM’s first axial point (FAP) onto the first peritoneal axial point (PAP), e.g. the east or west PAP; before doing so, he needs to visualize how to superimpose the SM’s axial points (APs) onto the corresponding PAPs. He must orientate the SM carefully, ensuring that its upper edge is parallel to the imaginary line between the north–south PAPs, as he looks at them. Only in this way can the surgeon correctly superimpose and fix the FAP onto the first PAP, and then the SM’s second AP onto the second PAP. Once the FAP and the SM’s second AP have been correctly fixed onto the corresponding PAPs, as a result of this the SM’s remaining two APs will be superimposed perfectly onto the corresponding PAPs.
Results: Our study comprised 41 males and 39 females, with overall mean age and BMI being 58 years old and 29 kg/m2 respectively. Fifty-four patients had a small/medium VH (S 2–4.9/Me 5–9.9 cm), 21 had a large/giant VH (L 10–14.9/G 15–19.9 cm), and 5 had a massive VH (M ≥ 20 cm). Mean surgical time (s.t.) was 100 min for all 80 patients, 90 min. for S/Me patients, 111 min. for L/G patients, and 169 min. for M patients. A composite mesh and a non-composite mesh were employed in 91% and 9% of cases respectively. Absorbable straps and titanium tacks were used in 81% and 19% of cases respectively. Mean hospital-stay was 2.5 days and mean f.u. time was 5 years. There was 1 case of postoperative chronic abdominal-wall pain (c.a.p.), and 8 late postoperative complications (p.c.): 5 VH recurrences and 3 trocar-site hernias.
Conclusions: Our l.t. analysis confirms that SM effectively reduces both s.t. and p.c., such as c.a.p. (1%) and VH recurrence (6%).
Hernia-adhesions—abdominal wall hernia
O075—Lira technique after medium follow-up. Results of a new minimal invasive procedure in ventral hernia repair
Julio Gómez-Menchero1, A. Gila Bohórquez1, J.L. Guerrero1, P. de la Herranz1, S. Morales-Conde2
1Hospital de Riotinto, Surgery, 2Hospital Universitario Virgen del Rocio, Spain
Background: LIRA technique (Laparoscopic Intracorporeal Rectus Aponeuroplasty) was described in 2018 in order to reduce the tension in the midline as an alternative for Closing the defect (CD) during Laparoscopic Ventral Hernia Repair. LIRA showed in preliminary results the same benefits of CD in order to decrease seroma, to improve the functionality of the abdominal wall but showed a significant decrease of the bulging effect in medium defects. We present the results in our LIRA series after 5 years performing this technique in patients over 1-year follow-up.
Methods: A prospective controlled study was conducted from January 2015 to December 2020 to evaluate an elective new procedure (LIRA) performed on patients with midline ventral hernias (4 to 10 cm width). The data analyzed included patient demographics, operative parameters and complications.
A Computerized Tomography was performed preoperatively and postoperatively (1 month and 1 year) to evaluate recurrence, distance between rectus and seroma.
Results: 49 patients were included. Mean Age was 58 ± 10.59 years old and BMI 33.11 ± 6.61 kg/m2. Mean width of the defect was 6.19 ± 1.49 cm. Average VAS (24 h) was 5.09 ± 5, 0.38(1 month) and 0 (1 year). Mean preoperative distance between rectus was 5.55 ± 1.61 cm; postoperative was 2.15 ± 0.79 cm (1 month) and 2.20 ± 0.68 cm (1 year). Radiological seroma at first month was detected in 40%. Seroma after 1 year was 4,08% Mean follow-up was 24 months. Bulging was detected only in 1 case (2.04%) of our series after 1 year follow up.
Conclusion: The LIRA technique in our experience could be considered as an alternative to conventional CD or endoscopic component separation for medium defects under 10 cm in width with a low rate of postoperative complication, that could be related to a low rate of postoperative pain with no recurrence and a low rate of bulging compared to CD, being a safe, feasible and reproducible technique for many surgeons.
Hernia-adhesions—abdominal wall hernia
O091—Minimally invasive extraperitoneal “no tension” ventral/incisional repair in males with severe rectus diastasis associated
Juan Bellido, A. Bellido, E Licardie, A. Tejada, M. Sanchez Ramirez
Virgen Macarena Hospital, Surgical Department, Spain
Introduction: When Ventral/incisional midline hernia and simultaneous rectus diastasis are diagnosed, surgical repair of both pathologies could be the best recommended option. Subcutaneous endoscopic repair techniques with anterior rectus sheaths plication, are published during the last years with acceptable results in terms of postoperative complications and recurrences.
A separation of the rectus sheaths more than 5 cm width is labelled severe diastasis. Endoscopic plication develops excessive midline tension that could increase recurrence rate patients with severe rectus diastasis.
Minimally invasive “Chevrel fashion” endoscopic repair (FESSA technique) was proposed in those patients to corrects both pathologies.
Material and methods: patient with midline ventral or incisional hernia and severe diastasis are included in a prospectively maintained databased and retrospectively analysed from January 2019 to December 2020.
Inclusion criteria: Patients aged between 18 and 80 years old, midline ventral/incisional hernias and rectus diastasis > 5 cm width.
Exclusion criteria: Previous mesh placed in onlay position, patients with contraindication for general anesthesia and incarcerated or strangulated hernias.
A suprapubic incision for 11 mm trocar placement and two smaller incisions on both sides for 5 mm trocars, are performed. Subcutaneous space is developed using 8 mmHg CO2 pressure in order to visualize and increase the working space.
A complete suprafascial dissection exposing the anterior layer of the rectus sheath on both sides, is performed.
An incision is made on the rectus sheath bilaterally exposing the bellies of both rectus muscles in order to perform a medial segments anterior layers plication of the rectus sheaths, using non-absorbable barbed suture nº0. the length of both incisions depends on the length of the diastasis and hernia, and the distance from the midline depends on the hernia and diastasis widths. This way, hernia and diastasis are corrected without tension, re-approximating the midline to its original position.
A self-adhesive mesh (Adhesix® (AH, Bard, USA) is placed and fixed to the external margin of the anterior layers of the rectus sheaths.
Variables measured: demographic, Hernia type, defect and diastasis widths. Intraoperative complications. Hospital stay, postoperative complications, pain (VAS) on 1th/7th/30thdays, functional recovery and cosmetic results( Eurahs Quality of life score for restriction and cosmesis) and recurrences.
variables were compared using nonparametric tests. Chi-square test was used to evaluate categorical data. p values of < 0,05 were considered statistically significant.
Results: 23 male patients were eligible. 2 patients were lost during the follow-up.
17 patients (73%) with midline ventral and 6 (17%) with incisional hernias. mean defect width 4 cm and mean diastasis width was 6 cm.
No intraoperative complications were identified. Hospital stay 1.3 days.
Postoperative complications: one postoperative suprapubic subcutaneous hematoma, requiring hematoma removal (4%) and 2 seromas were confirmed and solved after two months after surgery.
Mean Pain at postoperative day 1: 4, day 7: 2. Day 30:1. Significant differences were identified when preoperative and 30th postoperative day were compared (p < 0,05).
Mean functional recovery at 1 postoperative month (6,6 ± 2,2) was significantly improved compared to preoperatory (16,4 ± 1,2). Mean postoperative cosmetic results was 7,3 ± 1,2, significantly improved compared to preoperatory (12,6 ± 2,5).
Conclusion: Endoscopic suprapubic ventral hernia repair in males with severe rectus diastasis is an alternative to open or laparoscopic repair without generating excessive tension in midline, with promising postoperative results in terms of complications, functional and cosmetics results.
Hernia-adhesions—abdominal wall hernia
O093—Anterior component separation versus posterior component separation with transversus abdominus release in abdominal wall reconstruction for incision hernia
Sherif Albalkiny
Aneurin Bevan Heath Board, General surgery, United Kingdom
Background: abdominal wall reconstruction after huge incisional hernias considered one of challenges that face surgeons, component separations either Anterior Component Separation or Posterior Component Separation with Transversus Abdominus Release are novel and less expensive solutions for this problem.
Aim: This prospective randomized trial compares the results of Anterior Component Separation Procedure versus Posterior Component Separation with Transversus Abdominus Release in repair of Incisional Hernias.
Methods: This study included 40 patients who underwent surgical repair for Midline Incisional Hernias with defects larger than 5 cm in width, between March 2016 and October 2017 at Ain Shams University Hospitals. Patients were randomly assigned to surgical procedures. Patients in group Ι (n = 20) underwent Anterior Component Separation (ACS), and Patients in group II (n = 20) underwent Posterior Component Separation with Transversus Abdominus Release (PCS with TAR).
Results: In Group Ι(ACS), Wound Morbidity significantly exceeded that in group II (PCS with TAR) that 10 patients in group I(50%) developed surgical wound infection compared to four patients (20%) in group II.As regard Wound Dehiscence, Seven patients in group I had this Sequelae while two patients in group II had Wound Dehiscence. Hernia Recurrence occurred in seven patients (35%) in group I but only one patient (5%) in group II developed this.
Conclusion: PCS with TAR provides equivalent Myofascial advancement with significantly less wound Morbidity and recurrence rate when compared with ACS.
Hernia-adhesions—abdominal wall hernia
O112—Port site hernia after laparoscopic surgery. Some of the most important etiological factors in the development of this complication
Kastriot Haxhirexha1, A. Gjata2, A. Dogjani2
1Clinical Hospital, General Surgery, North Macedonia. 2Tirana University Hospital, General Surgery, Albania
Port site hernias continue to be a major problem in laparoscopic surgery. The causes of this type of hernia are numerous. The main ones are operative wound infection, obesity, male gender, diabetes, BPH, etc. However, in addition to these factors it seems that in the etiology of post laparoscopic port—site hernias are at least two other factors that have an impact on these complications.
Aim of the Study: To assess the role of different factors in the occurrence of incisional hernias. Especially the type of trocar used, and the site of removal of the extirpated organ are the aim of this study.
Material and Methods: All the 187 patients who were operated on at the General Surgery Department of the Clinical Hospital of Tetova between January, 2017 and June, 2019 on whom the surgical intervention was performed through laparoscopic techniques were included in this study. The reason for the surgical interventions has been various surgical pathologies of the abdomen such as cholecystolithiasis, acute appendicitis, cysts of the liver, ovaries and kidneys, etc. Postoperative complications in these patients, especially port site hernia will be in the focus of our study.
Results: Out of the total of 187 patients included in this study the occurrence of incisional hernia was recorded in six of them. In five patients the hernia was localized at the site of insertion of the supra-umbilical trocar, while in the other, the trocar was inserted below the xiphoid process. From our records it happened that in all these patients, with postoperative hernia, the insertion of the cannula was done with the cutting trocar. At the same time in all six patients with post laparoscopic hernia the surgical intervention performed was cholecystectomy or appendectomy. Thus the removal of the gallbladder and appendix, without the use of an endobag, was performed at the site of the hernia presentation. In all these patients the entrance gate infection in which the hernia has occurred, was registered in the early post operative period.
Conclusion: Of the many factors that increase the risk of incisional hernias, at the site of cannula insertion during laparoscopic interventions, it seems that the type of trocar and the place from which the extruded organ is removed, if it is done without the use of an endobag, are very important.
Hernia-adhesions—abdominal wall hernia
O123—Suturing the hernia defect with 3d-laparoscopy for intraperitoneal Vental hernia repair
Andrii Malynovskyi, I.I. Horbachuk, V.S. Ishenko, O.O. Mrost
Odessa national medical university, Robotic and endoscopic surgery, Ukraine
Aims: IPOM is still the most popular technique for umbilical and incisional hernia repair. Suturing of hernia defect and sac can decrease the rate of seromas and pseudo-recurrences, and improve cosmetic results. The need for suturing is still debateful. The aim was to compare the immediate results of suturing and non-suturing in IPOM procedures.
Methods: From 2017 till 2020, 28 patients underwent IPOM for medial ventral hernias. Group A had 17 patients with suturing of the hernia defect and sac (IPOM +) (W1 – 8 patients, W2 – 9 patients). Group B had 11 patients without suturing (6 patients—umbilical hernias, 5 patients with incisional hernias, all W1). Mean age was 58 (range, 35 – 75). There were 18 women and 10 men. The groups were comparable by age, gender and sizes of hernias. Suturing was done by non-absorbable 2–0 V-loc suture (Covidien) facilitated by 3D-laparoscopy (Epic 3DHD system, Wolf).
Results: There were no conversions and complications in both groups. The mean duration of procedure was 95 min (range, 60–120) in group A, and 45 min (range, 30–60) in group B (p < 0.05). The intensity of postoperative pain on postop day 1 was slightly larger in IPOM + group. In W1 hernias, the mean volume of seroma on postop day 2 was 0.8 ml (range, 0–4) in group A and 1.7 ml (range, 1–5) in group B (p > 0.05). In W2 hernias, the mean volume of seroma was 3.2 ml (range, 1–8) in group A and 7.5 ml (range, 2–20) in group B (p < 0.05). The cosmetic result 2 weeks after surgery was better in IPOM + group, especially in W2 hernias.
Conclusions: 1. In W1 hernias, there is no difference in the rate and volume of seromas between two techniques. In W2 hernias, IPOM + produces better cosmetic results and smaller rate and volume of postoperative seromas compared to standard IPOM. 2. 3D-laparoscopy improves performance of suturing the hernia defect and sac. 3. More cases collection and long-term follow-up is needed to prove that suturing the hernia defect and sac helps to avoid seromas and bulging, for distinct types and sizes of hernias.


Hernia-adhesions—abdominal wall hernia
O184—Predicting long-term risk of reoperations following abdominal and pelvic surgery in a nationwide Cohort Study
Masja Toneman1, P. Krielen1, J. Jaber4, T.D. Groenveld3, M.W.J. Stommel1, E.A. Griffiths5, M.C. Parker6, N.D. Bouvy2, H. van Goor1, R.P.G. ten Broek1
1Radboud University Medical Centre, Department of Surgery, 2Maastricht University Medical Centre, Department of Surgery, 3Ziekenhuis Gelderse Vallei, Department of Surgery, The Netherlands. 4Shamir Medical Center, Department of Surgery, Israel. 5University Hospitals Birmingham NHS Foundation Trust, Department of Upper Gastrointestinal Surgery, 6Darent Valley Hospital, Department of Surgery, United Kingdom
Introduction: Predicting the risk of reoperation after abdominal surgery is considered difficult and frequently underestimated by surgeons, as most reoperations are not related to the initial procedure and diagnosis. During reoperation adhesions increase complication risk and morbidity. The ability to predict the risk of future reoperation for the individual patient is relevant for surgeons and to guide informed consent procedures.
Methods: A nationwide cohort study was conducted including patients undergoing an initial abdominal or pelvic operation between June 1st 2009 and June 30th 2011 in Scotland. Nomograms based on multivariable prediction models were constructed for the 2- and 5-year overall risk of reoperation and risk of reoperation in the same surgical area. Internal cross-validation was applied to evaluate reliability.
Results: Of the 72,270 patients with an initial abdominal or pelvic surgery, 10,467 (14.5%) underwent reoperation at 5 years postoperatively. Prediction models were built for predicting the risk of reoperation overall (Fig. 1) and the risk of reoperation in the same area (Fig. 2). Associated risk factors were congruent in the prediction models; colorectal surgery, IBD diagnosis, younger age, open surgical approach, malignancy and female sex increased the risk for reoperation. After laparoscopic surgery, overall risk of reoperation was 19% lower (HR 0.81 95%CI 0.76–0.86) compared with open operations. Accuracy of the prediction model of reoperation overall was moderate (c-statistic 0.65) and the prediction model of reoperation risk for the same area good (c-statistic 0.71).
Conclusion: Nomograms were constructed to predict the risk of reoperation in the individual patient. The prediction models were robust in internal cross-validation and can be used prognostically in informed consent procedures and to guide future application of adhesion preventive methods.
Hernia-adhesions—abdominal wall hernia
O186—Pre-aponeurotic endoscopic repair (REPA) of diastasis recti: medium-term results from a single surgeon's experience
Salvatore Cuccomarino1, A. Jannaci1, L.D. Bonomo2
1Chivasso General Hospital, Department of Surgery, 1Città della Salute, University of Turin, Department of Surgery, Italy
Background: Diastasis recti (DR) is a condition affecting not only the abdominal wall, but also the function of lumbar muscles and pelvic floor, consequently influencing urinary and digestive functionality. Pre Aponeurotic Endoscopic Repair (REPA) is a minimally invasive, endoscopic technique alternative to abdominoplasty for the treatment of (DR). We present the medium-term results of REPA application by a single surgeon.
Methods: 172 patients underwent REPA for the treatment of diastasis recti between August 2017 and December 2019. 124 patients have been followed for at least a year. 63 patients responded to a survey on satisfaction and quality of life 18 months after surgery.
Results: We had 3 (2.4%) recurrences, of which 2 in the same patient. Main post-operative complications were 12 (9.7%) seromas, 3 (2.4%) hematomas, one (0.8%) wound infection, 3 (2.4%) cases of skin folds formation, a case (0.8%) of trophic cutaneous lesion. Postoperative quality of life, as stated by 63 patients that responded to the survey, was very satisfactory.
Conclusions: REPA is a safe, standardized and effective technique for DR treatment, representing a valid alternative to abdominoplasty and to transabdominal approaches. Since there is no need to access the peritoneal cavity, there are no risks of bowel damage and adhesions between intestine and prosthesis.
Hernia-adhesions—adhesions
O230—Laparoscopic treatment also improves recurrence rate in grade II and III adhesive small bowel obstruction
Francesco Roscio, F.C. Clerici, I.S. Scandroglio
ASST Valle Olona, General Surgery, Italy
Aim: To evaluate the effectiveness of laparoscopic treatment in case of adhesive small bowel obstruction (ASBO) classified as grade II and III by the American Association for the Surgery of Trauma (AAST). Our hypothesis was that a minimally invasive approach might improve outcomes and reduce the risk of recurrence in comparison to open treatment.
Materials and methods: A consecutive unselected series of 38 patients underwent emergency surgery for ASBO grade II and III from January 2013 to December 2016 was retrospectively evaluated. All the procedures were performed at the same institution. 20 patients were operated by a standard open approach (openAL), in the following 18 we performed a laparoscopic adhesiolysis (lapAL). All the presentations were of grade II and III according to AAST classification. Inclusion criteria were the hemodynamic stability and the evidence of a clear transition-point at pre-operative CT scan of the abdomen, for both the lapAL and the openAL cohort. A diagnostic presentation classifiable as AAST grade IV or higher, a surgical history with 3 or more median laparotomies, a mean loop diameter greater than 4-cm at CT scan, are all characteristics for which patients were treated directly by a traditional approach and not included in this study. We considered patients-, surgery- and hospital stay–related data, as well as 30-days and 3-years follow-up for a short- and long-term analysis respectively. The mean small bowel diameter was considered by measuring three different sites at CT scan examination. Comorbidity and post-operative complications were classified by Charlson comorbidity index (CCI) and Clavien-Dindo classification system (CDCS) respectively. Criteria for the discharge included absence of symptoms, passage of stool and the tolerance of a minimum of 3 meals without restrictions. A value of p < 0.05 was considered statistically significant. Results LapAL and openAL were homogeneous in terms of mean age (65.7 ± 11.0 vs 71.2 ± 12.2 yy; NS), BMI (24.8 ± 4.1 vs 25.8 ± 4.9 kg/m2; NS), previous laparotomies rate (1.5 ± 0.7 vs 1.2 ± 0.8; NS), CCI (1.8 ± 1.2 vs 2.3 ± 1.3; NS), mean bowel loop diameter (3.0 ± 0.3 vs 2.9 ± 0.3 cm; NS), AAST grade II/III (72.2/27.8% vs 75/25%) and ER to OR timing (16.7 ± 14.1 vs 19.8 ± 16.4 h; NS). Bowel ischemia rate was comparable (16.7 vs 30.0%; NS) and conversion rate for lapAL was 22.2%. Operative time emerged as statistically longer for openAL (74.4 ± 29.0 vs 93.5 ± 23.7 min; p 0.032), as well as estimated blood loss (34.7 ± 44.6 vs 90.2 ± 67.2 ml; p 0.005) and time of first stool (2.8 ± 0.8 vs 4.0 ± 1.4 dd; p 0.005). Length of stay was statistically comparable (5.5 ± 1.2 vs 6.2 ± 1.3 dd; NS) as well as CDCS for the two cohorts, and we had no 30-day readmissions or mortality. We recorded 3 cases of recurrence at 3-years follow-up for lapAL compared to 7 for openAL (16.6 vs. 35.0%; NS).
Conclusions: LapAL for ASBO AAST-EGS grade II and III was feasible and effective, ensuring a 3-years recurrence rate at least quantitatively lower than openAL.
Hernia-adhesions—adhesions
O231—Dilemma of testicular torsion: a single centre experience
Mohamed Salama1, W. Shabo1, Mahmoud Salama2, B Sami1, I. Ahmed1, A.R. Nasr1, S. El Masry1
1Our Lady of Lourdes Hospital, General Surgery, 2Trinity College Dublin,, Ireland
Introduction: The acute scrotum presents as a challenge for diagnosis and management requiring prompt surgical assessment. While it is common to have a negative scrotal exploration, several occasions of misdiagnosis or late interventions can have detrimental outcome.
Aims: 1. To examine our current practice of acute scrotal management and to highlight areas for improvement and focus on guideline recommendations. 2.To determine the surgical outcome of all scrotal explorations performed in our hospital for patients with suspected torsion.
Methods: A retrospective study for all patients who had testicular exploration in our hospital with suspected testicular torsion during the period of three years from January 2016-December 2018 was included. The parameters included: Demographics of patient, Date of presentation (season), Approaches to management (US/Surgical), Pathology found during surgery, Surgical intervention (orchidopexy/orchoidectomy/nil), Follow up.
Results: Total number: 120 (Right 53, Left 67, Age range: 3–76 years),
Torsion: 25 (20%) including orchidectomy × 4 (2 right and 2 left). Cyst of Morgagni: 33 (28%). No pathology: 62 (52%). 22 (18%) had US preoperatively: One confirmed torsion and exploration revealed varicocele, 3 US not conclusive, 18 US suggested torsion and exploration confirmed same. 98 (82%) Cases had no US preoperatively as US services were not available at time of presentation.
Three cases of orchidectomy were performed due to delayed presentation of the patient and one of them was three days post inguinal hernia repair (76 year old). 3 Cases of torsion were post hernia repair, and 3 were in undescended testis. 2 cases had dusky discoloration during surgery. Orchidopexy was performed and US follow up with normal testis.
Conclusions: Testicular torsion is a serious scrotal emergency. It must be excluded in all patients with acute scrotum. Prompt recognition and treatment are necessary for testicular salvage. If testicular torsion is clinically suspected, immediate surgical exploration is indicated. Negative exploration of the scrotum is more acceptable than the loss of a salvageable testis.
Hernia-adhesions—adhesions
O232—Robot-assisted treatment of epigastric hernias with a suprapubic approach
Francesco Mongelli1, R .Pini2, M. Di Giuseppe2, J.M.A. Toti2, M. Marcantonio2, S. Spampatti2, D. La Regina2
1Ospedale Regionale di Lugano, Surgery, 2Ospedale Regionale di Bellinzona e Valli, Surgery, Switzerland
Background: Robotic-assisted ventral hernia repair has shown itself to be feasible and safe in abdominal wall surgery. Presently, the ports are placed laterally to meet the distance from the fascial defect. The aim of our study is to report our experience of epigastric hernias treatment with the trocars’ insertion in the suprapubic region.
Patients and methods: On a prospectively collected dataset on robotic-assisted surgery, patients treated for epigastric hernias with suprapubic approach were identified. Demographic and clinical data were collected and analyzed.
Results: Twelve patients were selected. Median age was 58.5 years (interquartile range (IQR) 47.8–67.3) and four patients were male (33.3%). All patients were referred to surgery because of pain. The median measure of the hernia defect was 30 mm (IQR 13.75–31), median larger mesh diameter was 13.5 cm (IQR 9.5–15.0) and median operative time was 136.5 min (IQR 120–186.5). No intraoperative complication or conversion to open surgery occurred. Postoperatively, two patients presented a seroma and median length of hospital stay was 2.0 days (IQR 1.75–3).
Conclusions: In the robot-assisted treatment of epigastric hernias a suprapubic port placement can be considered instead of a lateral one. Further studies are needed to assess the benefits and limitations of such technique.


Hernia-adhesions—emergency surgery
O185—Impact of COVID-19 on emergency general surgical admission during the peak and patients’ reported satisfaction
Tarik Jichi
North Bristol Trust, Surgery, United Kingdom
Introduction: COVID-19 (C-19) is a zoonotic respiratory disease caused by severe acute respiratory syndrome coronavirus 2 (SARS-Cov-2) [1]. Since being declared a global pandemic by the World Health Organization [2], the C-19 pandemic has placed unprecedented strain on healthcare systems across the globe. All medical and surgical specialties have been affected by the ongoing pandemic including emergency surgery, yet the true impact of C-19 on health services is not fully understood. Our observational study aims to address this gap in research.
During the C-19 pandemic, both elective and emergency hospital services have been disrupted to reduce the hospital transmission of C-19, and to mitigate surgery-related mortality and morbidity across the globe [3]. Many surgeries in the UK have been postponed or cancelled during the peak of C-19 as per the Royal College of Surgeons (RCS) updated guidelines and the European Society of Trauma and Emergency Surgery [4].
Whilst there have been many studies that predicted or observed the effects of C-19 on cancellations of elective surgeries [5–10], there is a minimal focus on its impact on emergency surgical admissions. Additionally, given the high false negative swab rates, there are difficulties in establishing a confirmed diagnosis of C-19 and differentiating it from other viral illnesses or other types of pneumonia [11–13]. Currently reverse transcriptase-polymerase chain reaction (RT-PCR) assays from respiratory swabs and CT chest findings are considered the most reliable methods of C-19 diagnosis [14, 15]. This poses a real difficulty for a surgeon in decision making regarding emergency surgical intervention for patients with suspected C-19 symptoms and therefore many patients had CT Chest during their admission. This led to an unprecedented exposure of patients to radiation in the form of either diagnostic CT AP or CT CAP. This observational study looks at the numbers of diagnostic CT scans performed during the peak of the C-19 pandemic in a busy trauma centre as compared to non-COVID period.
Methods: This is a prospective study conducted in a busy trauma centre based in South-west of England. Data on all the patients who were admitted under emergency general surgical team between 23rd March and 23rd April 2020 during the peak of C-19 pandemic in our institute was collected to compare with retrospectively collected data during the similar period in 2019. We reviewed computerized clinical records, laboratory findings and radiological imaging for all the patients, accounting for their age and gender. Extensive surgical admission data was retrieved including primary diagnosis, diagnostic scans, investigation findings, surgical intervention, and readmission rate.
The main focus was the number of diagnostic computerized tomography (CT) and emergency surgeries performed during the C-19 peak (Group A) as compared to non-COVID period (Group B). We also attempted to contact all the patients by telephones who were admitted under emergency general surgical team during our study period at our follow-up time-point of August 2020 to record their satisfaction. The ‘Likert scale’ was used to assess the satisfaction rate.
Results Over the 1-month time period of our study, 191 patients were admitted at our institution under emergency general surgery team. Number of males was 46% compared to 54% females (87 males and 104 females). The median age was 66 years (Range 17- 97 years). Majority of admissions were reported by patients aged > 50 years (Fig. 1). Main indications for admission were biliary pathology in 23%, appendicitis 11%, bowel obstruction or ischaemic bowel 10%, and diverticulitis 7% (Table 1). Only 78 patients (41%) had a COVID-19 swab during their emergency admission as well as CT Chest and only 6 (8%) of them were positive.
Number of patients who underwent emergency surgical intervention were 40 (20%) and 151 (79%) were treated conservatively. Main surgical interventions were appendicectomy at 40% and laparotomy 20%. De-functioning stoma was formed in 20% patients for bowel obstruction as the main indication for surgery (Table 2). In addition, 3% (6 patients) end up in ITU with mean length of stay of 6 days. Total hospital length of stay in 65% of the patients was between 1 to 3 days and 7% stayed for more than a week (Table 3). Re-admission rate was 28% (54 patients) in first 4 months.
Post-operative 30-day mortality was 8% (4 patients) and one of them had a positive COVID-19 swab. In addition, number of patients deceased during their index admission without any intervention were 8 (6%). At the time of 4 monthly FU, further 3 deaths were reported. Mortality rate was high in patients older than 70 years at 20% (13/66) and more in male than females. Table 4 highlights admission and mortality rate for different age groups.
In Group A, a diagnostic CT abdomen-pelvis (AP) was performed for 74% of the patients compared to 47% in Group B (p = < 0.05). Interestingly, 48% of patients in Group A had a diagnostic CT Chest as well all patient who had CT Chest in group A had PCR swap done, compared to 2% in Group B (p = < 0.05). The number of patients who were treated conservatively in Group A were 138 (72%) as compared to 201 (74%) in Group B (Table 5). There was no significant difference in the number of emergency surgeries performed in Group A and B (p = 0.12). Table 2 demonstrates the type of surgical interventions in Group A and B.
The number of patients admitted to ITU were 6 (3%) in Group A compared to15 (6%) in Group B.
In group A, out of the RTA’s admitted four had a chest drain inserted, and of the pancreatitic patients three of them had ERCP for gallstones impaction in the CBD. Furthermore, three patients presented with large bowel obstruction / sigmoid volvulas and had to have flexible sigmoidscopy for decompression. Out of our 40 surgical interventions 8 patients had a stoma formed for either defunctioning or part of a laprtomy and one patient had a stoma to divert stool from his back passage as underwent extensive debridment of the perianal region for a necrotizing fasciatitis infection.
At the time of 4 monthly follow up, total number of deaths were 15 (8%). An attempt was made to contact rest of the 176 patients. The total number of patients who were contacted successfully by telephone was 75 (43%). Of the 75 patients who participated in our survey, 54 (72%) were ‘Very Satisfied’, 15 (20%) were ‘Satisfied’, 2 (3%) were ‘Neutral’, 3 (4%) were ‘Dissatisfied’ and only 1 (2%) was ‘Very Dissatisfied’ with the surgical care received during their admission, as shown in Fig. 4. Overall, 92% of the patients were satisfied with their surgical outcome.
Conclusion: This observational study demonstrates that our unit continued to deliver high quality surgical care to all the admitted patients during the peak of COVID-19 pandemic, with majority of our patients reported satisfied.

Figure 2 A comparison of the emergency surgical interventions in Group A (n = 40)/Group B (n = 69)

Hernia-adhesions—emergency surgery
O202—Common general surgical never events: an in-depth analysis of never events data held by NHS England
Islam Omar1, R. Singhal2, M. Wilson3, C. Parmar4, O. Khan5, K. Mahawar1
1Sunderland Royal Hospital, South Tyneside and Sunderland NHS Trust, Bariatric Unit, Department of General Surgery, 2Birmingham Heartlands Hospital, University Hospital Birmingham NHS Foundation Trust, UGI Surgery, 3NHS Forth Valley, Upper GI Surgery, 4Whittington Health NHS Trust, Upper GI Surgery, 5St. George's University Hospitals NHS Foundation Trust, General and Upper GI Surgery, United Kingdom
Background: There is little available data on common general surgical NE. Lack of this information may have affected our attempts to reduce the incidence of these potentially serious clinical incidents. The purpose of this study was to identify common general surgical NE from the data held by the National Health Service (NHS) England (Table 1).
Table 1.
All General Surgical Never Events
| 2012–2013 | 2013–2014 | 2014–2015 | 2015–2016 | 2016–2017 | 2017–2018 | 2018–2019 | 2019–2020 | Total | |
|---|---|---|---|---|---|---|---|---|---|
| Wrong site surgery | 54 | 62 | 51 | 48 | 51 | 55 | 50 | 56 | 427 |
| Retained items post procedure | 68 | 47 | 47 | 41 | 42 | 44 | 31 | 35 | 355 |
| Wrong implant/ prosthesis | 0 | 1 | 1 | 1 | 2 | 6 | 3 | 1 | 15 |
| Total | 122 | 110 | 99 | 90 | 95 | 105 | 84 | 92 | 797 |
Methods: We analyzed NHS England NE data from April 2012 to February 2020 to identify common general surgical NE.
Results: There was a total of 797 general surgical NE identified under three main categories of Wrong-Site Surgery (n = 427;53.58%), Retained Items Post-Procedure (n = 355; 44.54%) and Wrong Implant/ Prosthesis and (n = 15; 1.88%). We identified a total of 56 common general surgical themes—25 each in Wrong-Site Surgery and Retained Foreign Body category and 6 in wrong implants.
Wrong skin condition surgery was the commonest wrong-site surgery (n = 117; 27.4%). There were 18 wrong side chest drains (4.2%) and 18 (4.2%) wrong side angioplasty/angiogram. There were 7 (1.6%) instances of confusion in pilonidal/perianal/perineal surgeries and 6 (1.4%) instances of biopsy of cervix rather than colon or rectum.
Retained surgical swabs were the most common retained items (n = 165;46.5%). There were 28 (7.9%) laparoscopic retrieval bags with or without the specimen, 26 (7.3%) chest drain guidewires, 26 (7.3%) surgical needles; and 9 (2.5%) surgical drains. Wrong stents were the most common (n = 9;60%) wrong implant followed by wrong breast implants (n = 2;13.3%).
Conclusion: This study found 56 common general surgical Never Events. This information is not available to surgeons around the world. Increased awareness of these common themes of NE may allow for the adoption of more effective, specific safeguards and ultimately help reduce their incidence.
Figure 1 Proportins of general surgical never events

Hernia-adhesions—emergency surgery
O233—Is laparoscopic appendectomy safe enough during all trimesters of pregnancy?
Baris Mantoglu, E. Gonullu, F. Altintoprak
Sakarya University Teaching and Research Hospital, General Surgery, Turkey
Aims: Although laparoscopic appendectomy increases its popularity today, the answer to the question of whether to perform open or laparoscopic appendectomy during pregnancy is appropriate in many studies the choice of surgery depends on the surgeon. Undesirable outcomes of pregnancy may be independent of surgical intervention, except for the disease. Herein, we aimed to evaluate the six years experience of our clinic on appendicitis in pregnancy (Tables 1 and 2).
Table 1.
The relationship of trimester and surgical technique with abortion and preterm
| Type of surgery | Outcomes | P value | Effect size | ||
|---|---|---|---|---|---|
| Term | Preterm + Abort | ||||
| Trimester – 1 | Open | 10 (83.3%) | 2 (16.7%) | 1,000 | 0,057 |
| Laparoscopic | 8 (88.8%) | 1 (11.2%) | |||
| Trimester – 2 | Open | 16 (84.2%) | 3 (15.8%) | 0,685 | 0,079 |
| Laparoscopic | 22 (84.6%) | 4 (15.4%) | |||
| Trimester – 3 | Open | 8 (66.6%) | 4 (33.4%) | 1,000 | 0,164 |
| Laparoscopic | 5 (83.3%) | 1 (16.7%) | |||
Table 2.
Relationship of surgical technique with abortion and preterm
| Outcomes | Chi square | P value | Effect size | |||
|---|---|---|---|---|---|---|
| Term | Preterm + Abort | |||||
| Surgery | Open | 34 (79.1%) | 9 (20.9%) | 0.007 | 0.934 | 0.043 |
| Laparoscopic | 35 (85.4%) | 6 (14.6%) | ||||
Methods: Eighty-four pregnant patients with acute appendicitis who underwent laparoscopic or open technique intervention enrolled in this retrospective study. The patients were divided into two groups according to the surgical interventions. In addition to the demographic structure of the patients, the number of pregnancies, pathological results, laboratory values, radiological imaging methods, length of hospital stay were also evaluated.
Results: The mean age of the pregnant patients was 29.7 ± 5. Of the 84 pregnant women with appendicitis, 48.6% had their first pregnancy, 38.1% had their second pregnancy, and 13.3% had three or more pregnancies. The preterm delivery and abortus were 20.9% in the open appendectomy group and 14.6% in the laparoscopic appendectomy group, and there was no statistical difference in pregnancy outcomes in all trimesters. The mean hospital stay was one day in the laparoscopic appendectomy group and two days in the open appendectomy group. Preoperative c- reactive protein was the only laboratory finding, which was found to be statistically significantly higher in patients with preterm birth (p ≤ 0.05).
Conclusion: Performing laparoscopic or open surgery is the choice of the surgeon in appendicitis encountered during pregnancy. We anticipate that appendicitis itself may cause undesired statuses such as abortus or preterm delivery, so it may be appropriate to achieve the consequence with the least invasive method in all trimesters of pregnancy if possible.
Hernia-adhesions—emergency surgery
O235—Interval appendicectomy in the era with effective antibiotics, modern CT and laparoscopy: a single irish centre experience & literature review
Mohamed Salama1, Farah Kazi1, F. Kazi1, Mahmoud Salama2, B. Sami1, A.R. Nasr1
1Our Lady of Lourdes Hospital, General Surgery, Drogheda, 2Trinity College Dublin, Ireland
Introduction: Treatment of complicated appendicitis remains challenging and controversial as immediate appendicectomy is technically demanding. Interval appendicectomy remains questionable and entirely conservative management is still debatable. Aims: To evaluate the need for interval appendicectomy for complicated appendicitis and incidence of appendiceal neoplasm following it.
Methods: A retrospective study included all patients with appendicitis treated either conservatively, emergency appendicectomy or interval appendicectomy between 2008 and 2018 in our hospital. Incidental appendicectomy cases were excluded.
Results: 4869 cases (M- 2425, F- 2444) who presented with acute appendicitis were included in our study. 4506 (92.5%) patients (M- 2215, F- 2291) had emergency appendicectomy. Total number treated conservatively were n = 363. Out of this, 258 (5.3% of total) patients were treated entirely conservatively (M: 111, F: 147, age range: 5-96yrs). Length of hospital stay (LOS) range: 1–32 days. Average LOS: 5 days. Readmission within 1 year was 54 (M: 26, F: 28), of which 48 were admitted once and 6 cases (2.2%) admitted twice. Remaining 105 patients underwent interval appendicectomy (2.2%) (M: 49, F: 56; Laparoscopic: 94, Open: 11; age range: 6-75 years). Average LOS: 3 days. Histology: Chronic appendicitis: 35, Normal Appendix: 21, LAMN: 17, Faecoliths: 17, Endometriosis: 3, Parasite 3, Diverticuli: 3, Adenoma: 3, Crohn’s: 1, Carcinoid 1, Adenocarcinoma: 1. Almost all tumour cases were diagnosed pre-operatively (14 by CT, 4 by colonoscopy, 1 by US, 1 by MRI, only 1 case of LAMN (37 year old patient) was not diagnosed preoperatively had US but not CT or colonoscopy).
Conclusions: There is no clear standardised approach to complicated appendicitis with treatment varying from immediate appendicectomy versus non-operative management with antibiotics and possible interval appendicectomy • Immediate surgical management of complicated appendicitis remains a gold standard and should be used in most patients • If emergency laparoscopic appendicectomy is to become the standard of care for complicated appendicitis, interval appendicectomy will certainly become something of the past Our study and current evidence suggest interval appendicectomy may never be necessary but may be an option in selected cases.
Hernia-adhesions—inguinal hernia
O095—Emergent laparoscopic repair of incarcerated and strangulated hernias
Guy Steinberg Barkon, J. Rachmuth, I. Carmeli, S. Rayman, Y. Mnouskin, A. Keidar
Assuta Ashdod, General Surgery, Israel
Background: Incarcerated and strangulated hernias present a major problem in emergency medicine. There is scarce data about the role of laparoscopy in the management of these patients. Laparoscopic repair offers the benefits of the ability to survey the incarcerated organ and to evaluate its viability, apart from the obvious advantages of laparoscopic surgery. The use of mesh repair in these emergent operations is also a major concern. In this series we aimed to evaluate the safety and efficacy of laparoscopic emergent repair of incarcerated and strangulated hernias.
Methods: Retrospective review of prospectively collected data of all the patients who underwent emergent laparoscopy due to an incarcerated and strangulated hernia between November 2017 and March 2021. All inguinal hernias were repaired using the TAPP approach and ventral hernias using the IPOM + approach. The follow-up was made through validated telephone questionnaire or clinic visit.
Results: During the study period, 54 patients underwent emergent laparoscopy due to incarcerated hernias (28 females, 26 males). 26 patients had an inguinal hernia, 25 patients had ventral hernia, 2 femoral hernia and one had a spigelian hernia. 33 patients had small bowel contained in the hernial sac, 15 had large bowel, 8 had omentum and 2 had urinary bladder. There were total of 7 bowel resections. There were no major intra-operative complications. During the peri-operative period there were 2 mortalities and 9 minor complications. Mean follow-up time was 606 days, During the post-operative period there were no major complication and 14 minor complications – mostly postoperative pain or seroma which resolved spontaneously. During long term follow-up 2 patients had non-symptomatic recurrence and no patient had reoperation.
Conclusion: laparoscopic emergent repair of incarcerated hernias is a feasible approach, with comparable results to open emergent operations. Further studies with longer follow up time need to be conducted, in order to evaluate the added benefit of the laparoscopic approach in the long term.
Key words: inguinal, ventral, hernia, laparoscopy, emergency, strangulation.
Hernia-adhesions—inguinal hernia
O182—Proficiency-based training in laparoscopic inguinal hernia repair: a prospective cohort study
Guy Steinberg Barkon, S. Rayman, Y. Mnouskin, A. Keidar
Assuta Ashdod, General Surgery, Israel
Aim: Examine the ability of residents to independently perform laparoscopic enhanced-view Total Extra-Peritoneal (eTEP) inguinal hernia repair with proficiency, competence and confidence, following a proficiency-based training (PBT) course.
Methods: Prospective analysis of eTEP procedures performed by residents between March 2018 and September 2020. Six residents from different general surgery departments were dispersed into 3 groups—Group A: two junior residents (PGY2), Group B: two mid-level residents (PGY3-4) and Group C: Two Senior residents (PGY5). The course comprised of theoretical and practical stages, which included lectures, videos, e-learning, simulation and assisting and performing eTEP, which was divided into 5 steps. Data reviewed for each procedure included the time of each step, total time, intraoperative and postoperative complications along with autonomy degree as assessed by an attending for every step: 1st degree- dependent (physical assistance), 2nd degree- partially dependent (vocal assistance) and 3rd degree-independent. The initial 50% of procedures were referred to as early procedures and the remaining 50% were referred to as late procedures.
Results: Participants performed 44 procedures (220 steps) that were include in the final analysis. Late procedures presented with a significant improvement in all degrees of autonomy (1st degree p = 0.002, 2nd degree p = 0.007 and 3rd degree p < 0.0001) and in every step (Step 1 p = 0.015, Step 2 p = 0.006, Step 3 p < 0.0001, Step 4 p < 0.0001, Step 5 p = 0.002). There was no significant difference in surgery duration between early and late procedures (p = 0.32). At early procedures junior residents (groups A + B) needed significantly higher rates of physical intervention (1st degree) compared to the senior residents (group C) (p = 0.004). Conversely, there was no significant difference in 2nd degree of autonomy (p = 0.46), 3rd degree (p = 0.06) and surgery duration (p = 0.16). The last 3 procedures performed by all participants had no significant difference between the seniority groups in autonomy (1st degree p = 0.1, 2nd degree p = 0.18 and 3rd degree p = 0.1).
Conclusion: PBT is effective in achieving competence, autonomy and confidence in performing eTEP in a short time. PBT reduces the learning curve of laparoscopic inguinal hernia repair.
Robotics & new techniques—bariatrics
O026—Comparative analysis of robotic versus laparoscopic Roux-en-Y gastric bypass in severely obese patients
Panagiotis Lainas1, R. Kassir2, M. Benois3, J. Derienne1, T. Debs3, M. Safieddine4, C. Del Basso1, J. Gugenheim3, I. Dagher1, I.B. Amor3
1Antoine-Beclere Hospital, Department of Minimally Invasive Digestive Surgery, 2CHU Felix-Guyon, Department of Digestive and Bariatric Surgery, 3Archet II Hospital, Department of Digestive Surgery, 4CHU Felix-Guyon Methodological Support Unit, INSERM, France
Aims: Benefits of robotic surgery for Roux-en-Y gastric bypass (RYGB) are still debated. We aimed to compare conventional laparoscopic (L-RYGB) to robotic RYGB (R-RYGB) and evaluate safety, efficacy, advantages and drawbacks of each procedure.
Methods: A prospective cohort study with a retrospective review approach was conducted to analyze results of L-RYGB and R-RYGB performed at a bariatric center of excellence. Patient demographics, perioperative data, weight loss, comorbidities evolution and cost were assessed.
Results: One-hundred and 61 severely obese patients underwent R-RYGB and L-RYGB, respectively. Patient’s characteristics were similar between groups. Intraoperative blood loss was similar (p = 0.91), with no requirement for blood transfusion. Median operative time was significantly reduced for R-RYGB (127 vs 160 min; p < 0.001). Seven patients (11.4%) in the L-RYGB group and 15 patients (15%) in the R-RYGB group had early postoperative complications (p = 0.63), with more anastomotic leaks and stenosis for R-RYGB during initial learning curve (p = NS). Mortality was null. Median length of hospital stay was similar (6 days; p = 0.20). Mean hospital cost was non-significantly increased for R-RYGB ($5730 vs. $4879; p = 0.34). Two years after surgery, median BMI and mean EWL% were similar for both groups (26.1 vs 26.5 kg/m2 and 89.9% vs 90.9% for L-RYGB and R-RYGB groups, respectively; p = 0.71 and 0.85, respectively), with no statistically significant difference in comorbidities between the two groups (p = 0.80).
Conclusions: R-RYGB is feasible and safe within the reach of every laparoscopic surgeon. In our series, it was associated with shorter operative time and equivalent length of stay and weight loss outcomes compared to L-RYGB. Further well-designed randomized studies are necessary to draw safe conclusions.
Robotics & new techniques—bariatrics
O028—Robotic vs laparoscopic approach for single anastomosis duodenal-ileal bypass with sleeve gastrectomy (SADI-S): a propensity score matching analysis
Francesco Pennestrì1, L. Sessa1, G. Salvi1, P. Gallucci1, L. Ciccoritti1, F. Greco1, C. De Crea2, M. Raffaelli2
1Fondazione Policlinico Universitario Agostino Gemelli IRCCS, Division of Endocrine and Metabolic Surgery, 2Fondazione Policlinico Universitario Agostino Gemelli IRCCS—Università Cattolica del Sacro Cuore, Division of Endocrine and Metabolic Surgery,—Italy
Aims: Biliopancreatic diversion with duodenal switch and single anastomosis duodenal-ileal bypass with sleeve gastrectomy (SADI-S) are technically demanding hypo-absorptive bariatric procedures generally indicated in superobese patients (BMI > 50 kg/m2). In these cases, robotic platform could improve ergonomics against a thick abdominal wall, preventing bending of instruments and simplifying hand-sewn anastomoses. Data comparing laparoscopic and robotic approaches for SADI-S are lacking. We aimed to report our experience with robotic SADI-S (R-SADI-S) and to compare outcomes with the laparoscopic (L-SADI-S) approach, using propensity score matching (PSM) analysis.
Methods: Among 1777 patients who underwent bariatric procedures at our institution, between July 2016 and November 2020, 94 (5.3%) consenting patients were scheduled for SADI-S as primary or revisional procedure (83 L-SADI-S, 11 R-SADI-S). R-SADI-S patients were matched with L-SADI-S ones using PSM analysis to overcome patient selection bias (age, gender, BMI, primary/revisional procedure). Postoperative complications, operative time (OT), post-operative stay (POS), and follow-up data were compared between the groups.
Results: After PSM, 22 patients (11 patients for each group) were apiece compared (chi-square 7.717, p = 0.636). Median age, gender, median BMI, preoperative rates of comorbidities, previous bariatric procedures, previous abdominal non-bariatric surgeries, type of surgical procedures (SADI-S/SADI), median POS were comparable. Median OT was shorter in the L-SADI-S group (144 Vs 200 min, p = 0.160). No 30-day complications were registered. One patient (L-SADI-S group) developed Wernicke encephalopathy 6 months after surgery, but he was non-compliant to multivitamin supplementation. At mean follow-up of 14.6 months, the median Percentage Excess Weight Loss was 69.9%, and was comparable between the groups (p = 0.902).
Conclusions: R-SADI-S and L-SADI-S were comparable in terms of complication rate and short-term outcomes. The robotic platform may represent an added value in the most challenging cases (BMI > 60 kg/m2, patients with previous multiple abdominal surgery) safely increasing the rate of single step procedure. Larger studies with longer follow-up and cost-analysis are necessary to draw definitive conclusions.
Robotics & new techniques—basic and technical research
O078—Surveying operating room staff attitudes: is working in a Black Box monitored operation room of influence on patient safety?
Anne Sophie van Dalen, E.Z. Barsom, M.P. Schijven
Amsterdam UMC, location AMC, Surgery, The Netherlands
Background: An operating room Black Box® (ORBB), a medical data recorder, was implemented in one operating room (OR) of our tertiary referral centre. Its output was used as template underpinning structured postoperative team debriefings. The aim of this study was to determine OR staff attitudes and beliefs towards patient safety culture in the OR and to assess associations between ORBB participants and attitude towards patients safety.
Methods: The Dutch version of the validated Hospital Survey on Patient Safety Culture was administered to all professionals working in the OR complex. Ten questions regarding the use of the ORBB were added. The mean and the positive response rates (PRR) of the 11 patient safety culture dimensions in the questionnaire were calculated.
Results: In total, 126 professionals completed the survey (Table 1). Overall perception on patient safety was scored with a mean of 3.06 (SD 0.46) on a 5-point Likert Scale with PRR of 23.81%. Safety dimensions achieved lower scores from the OR nurses compared to the other professionals in the OR. Overall, the attitude of OR professionals participating in team debriefings using ORBB is positively correlated with their perception on patient safety (P-value < 0.024, 95%, CI 0.034–0.474, Bèta-coefficient 0.196) (Table 3).
Table 1.
Baseline Characteristics (N = 126)
| N completed survey | % of total | N received survey (response rate per department) | |
|---|---|---|---|
| Department | |||
| Anaesthesiology | 49 | 38.89 | 231 (21.21%) |
| General Surgery | 17 | 13.49 | 51 (33.33%) |
| Operating Room Complex | 35 | 27.78 | 139 (25.18%) |
| Urology | 4 | 3.17 | 14 (28.57%) |
| Neurosurgery | 5 | 3.97 | 13 (38.46%) |
| Orthopaedic surgery | 3 | 2.38 | 19 (15.79%) |
| Paediatric surgery | 2 | 1.59 | 9 (22.22%) |
| Cardiothoracic surgery | 2 | 1.59 | 9 (22.22%) |
| Plastic surgery | 1 | 0.79 | 6 (16.67%) |
| Gynaecology | 6 | 4.76 | 28 (21.43%) |
| Ear, Nose and Throat (ENT) | 2 | 1.59 | 2 (100%) |
| Years working at hospital? | |||
| < 1 years | 4 | 3.17 | – |
| 1–5 years | 29 | 23.02 | – |
| 6–10 years | 31 | 24.6 | – |
| 11–15 years | 23 | 18.25 | – |
| 16–20 years | 11 | 8.73 | – |
| > 20 years | 28 | 22.22 | – |
| Years working at current department? | – | ||
| < 1 years | 6 | 4.76 | – |
| 1–5 years | 32 | 23.1 | – |
| 6–10 years | 30 | 25.4 | – |
| 11–15 years | 22 | 17.46 | – |
| 16–20 years | 10 | 7.94 | – |
| > 20 years | 26 | 20.63 | – |
| How many hours per week? | – | ||
| < 20 h/week | 6 | 4.76 | – |
| 20–39 h/week | 61 | 4.3 | – |
| 40–59 h/week | 44 | 48.41 | – |
| 60–79 h/week | 14 | 11.11 | – |
| > 79 h/week | 1 | 0.79 | – |
| Role at department? | |||
| Staff surgeon (including orthopaedic-, plastic-, paediatric-, cardiothoracic-, neuro-) | 31 | 24.6 | 80 (38.75%) |
| Staff anaesthesiologist | 22 | 17.46 | 71 (30.99%) |
| Surgical fellow | 1 | 0.79 | 4 (25%) |
| Surgeon in training | 4 | 3.17 | 23 (17.39%) |
| Anaesthesiologist in training | 7 | 5.56 | 74 (9.46%) |
| Anaesthesia nurse | 20 | 15.87 | 86 (23.26%) |
| Operating nurse | 29 | 23.02 | 139 (20.86%) |
| Other | 10 | 7.94 | 44 (22.73%) |
| How long working within this role? | |||
| < 1 year | 5 | 3.97 | – |
| 1–5 years | 28 | 22.22 | – |
| 6–10 years | 23 | 18.25 | |
| 11–15 years | 22 | 17.46 | – |
| 16–20 years | 14 | 11.11 | – |
| > 20 years | 34 | 26.98 | – |
| In contact with patients? | |||
| Yes | 120 | 95.23 | – |
| No | 6 | 4.76 | – |
| Participated in the OR Black Box trial? | |||
| Yes | 18 | 14.3 | – |
| No | 108 | 85.7 | – |
Table 3.
Differences in attitudes towards the 11 patient safety dimension between participants of the Black Box Trial (N = 18) and those who did not (N = 108) participate (Means 5-point Likert scale)
| Patient safety | |||
|---|---|---|---|
| Dimensions Worked with ORBB (Mean, SD) | N = 18 Did not work with ORBB (Mean, SD) | N = 108 P-value (One way ANOVA) | |
| 1.Teamwork across departments | 2.92 (0.42) | 3.03 (0.46) | P 0.35 |
| 2.Teamwork within department | 3.68 (0.75) | 3.69 (0.62) | P 0.93 |
| 3.Changing Shifts | 2.78 (0.52) | 2.92 (0.47) | P 0.24 |
| 4.Frequency of incident reporting | 3.43 (1.02) | 3.30 (0.82) | P 0.59 |
| 5.Non-punitive response to error | 3.13 (0.67) | 3.17 (0.59) | P 0.81 |
| 6.Communication openness | 3.56 (0.67) | 3.60 (0.78) | P 0.80 |
| 7.Feedback and learning from errors | 3.73 (0.54) | 3.48 (0.63) | P 0.12 |
| 8.Supervisor expectations and actions promoting safety | 3.63 (0.74) | 3.52 (0.79) | P 0.60 |
| 9.Hospital management support for patient safety | 3.20 (0.31) | 3.10 (0.41) | P 0.29 |
| 10.Adequate staffing | 2.87 (0.66) | 3.01 (0.70) | P 0.42 |
| 11.Overall perception of patient safety | |||
Conclusions Professional participation in ORBB assisted debriefings may improve the overall attitudes towards patient safety, which is believed to strengthen OR teams in joint perception on surgical safety culture. The results of this study may help centres to implement this quality and safety improvement system more broadly and in a sustainable manner.
Robotics & new techniques—basic and technical research
O124—The current and possible future role of 3D modelling within upper gastrointestinal surgery: a scoping review
Henry Robb1, G. Scrimgeour2, P. Boshier3, S. Balyasnikova4, G. Brown4, F. Bello5, C. Kontovounisios6
Imperial College London NHS Healthcare Trust, 1Colorectal Surgery, 2Urology, 3Upper GI surgery, 4 Royal Marsden Hospital, Radiology, 5Imperial College London, Faculty of Medicine, Department of Surgery & Cancer, 6Royal Marsden hospital, Colorectal Surgery, United Kingdom
Aims: This scoping review aims to be the first literature to consolidate and analyse the current and possible future role of 3D modelling in upper gastrointestinal surgery, therefore guiding future research into the application of 3D modelling.
Methods: A scoping review protocol was developed following the internationally accepted framework created by Arksey and O’Malley, further refined by Levac et al. A comprehensive tailored search strategy using keywords, thesauri and Boolean Operators was created for selected databased including MEDLINE, Embase, Elsevier Scopus and ISI Web of Science. Databases were searched from their inception to 1/6/2020. The reference lists from selected studies were reviewed by hand using a ‘snowball search’ methodology to identify additional relevant literature. The protocol was registered to the Open Science Framework (osf.io/ta789) and the search strategy, inclusion and exclusion criteria can be found here.
A two-stage screening process of ‘title and abstract screening’ and ‘full text review’ was performed by two independent reviewers. Any disagreement was resolved through discussion and if required, the third reviewer provided a decisive vote. A data charting tool was created to collect quantitative data and allow for a qualitative thematic analysis.
Results: After databases searching and duplicate removal 2074 studies were identified. Following abstract and title screening, and full text review 51 studies were included. Grey literature and reference searchers added 6 studies, resulting in 57 for analysis. Thematic analysis found 52 studies under the theme surgical planning and procedure, with 45 on preoperative guidance and 7 on intraoperative guidance. Only 5 studies researched surgical training and education. There were no studies exploring patient engagement and education. 88% of the current literature was of level III grade evidence and below.
Conclusions: While there is a growing body of work demonstrating the benefit of 3D modelling with surgical planning and procedure, there is a lack of high-quality evidence demonstrating qualitative improvement to patient outcome. Researchers should aim to demonstrate through randomised control trials the benefits of 3D modelling on patient care. Other surgical specialties have demonstrated significant benefit for 3D modelling on surgical education and patient engagement, this work should be mirrored by upper gastrointestinal surgery.
Robotics & new techniques—basic and technical research
O204—Influence of intraoperative vasopressor use on indocyanine green fluorescence angiography: first evaluation in an experimental model
Mahdi Al-Taher1, Tim Pruimboom2, R.M. Schols2, N. Okamoto3, N.D. Bouvy1, L.P.S. Stassen1, R.R.W.J. van der Hulst2, K. Kugler3, A. Hostettler3, E. Noll3, J. Marescaux3, S. Diemunsch4, M. Diana3
Maastricht University & Maastricht University Medical Center, 1Department of Surgery, 2NUTRIM School of Nutrition and Translational Research in Metabolism, The Netherlands.3IRCAD, Research Institute against Digestive Cancer, 4University Hospital of Strasbourg, Department of Anesthesiology, Critical Care and Prehospital Emergency Medicine, France
Aims: Intraoperative indocyanine green (ICG) fluorescence angiography has gained popularity and acceptance in many surgical fields for real-time assessment of tissue perfusion. In gastrointestinal surgery, it has been demonstrated that ICG fluorescence angiography seems to reduce anastomotic leakage rates as compared to conventional techniques. Although vasopressors have the potential to preclude an accurate assessment of tissue perfusion, there is a lack of literature regarding its effect on ICG fluorescence angiography. The aim of this pilot study was to investigate the effect of increasing doses of norepinephrine on bowel perfusion assessment using ICG fluorescence angiography in an experimental model.
Methods: An experimental porcine model was used to expose the small bowel for tissue perfusion assessment. Three increasing doses of norepinephrine infusion (0.1, 0.5, and 1.0 µg/kg/min) were administered intravenously over a 25-min interval (See Fig. 1 for study flowchart). The fluorescence signal emitted by ICG was analyzed as a virtual perfusion cartography and overlapped onto the images to provide fluorescence-based enhanced reality (FLER). In each image, four regions of interest (ROIs) were randomly selected. Time-to-peak fluorescence intensity (TTP) was the primary outcome. Secondary outcomes included absolute fluorescence intensity and local capillary lactate (LCL) levels.
Results: Five large white pigs (mean weight: 40.3 ± 4.24 kg) were included. There was no significant difference in mean TTP (in seconds) at baseline (4.23) as compared to the first (3.90), second (4.41), third (4.60), and fourth ICG assessment (5.99). As a result of ICG accumulation, the mean and the maximum absolute fluorescence intensity were significantly different as compared to the baseline assessment. There was no significant difference in LCL (in mmol/L) at baseline (0.74) as compared to the first (0.82), second (0.64), third (0.60), and fourth assessment (0.62).
Conclusions: Increasing doses of norepinephrine infusion have no statistically significant effect on bowel perfusion assessment as the TTP fluorescence intensity remains constant during FLER analysis. Secondly, ICG accumulation was observed when using absolute fluorescence intensity, which reflects the need for a dynamic fluorescence videography technique over absolute fluorescence intensity in case of repeat perfusion assessments.
Robotics & new techniques—basic and technical research
O224—Optimizing surgical video annotation for artificial intelligence by majority voting of multi-rater-annotations
Jonathan Zhiyuan Chen1, A. Schulze1, P.M. Scheikl2, B.K Müller1, M. Capek1, T. Davistashvili1, P.A. Petrynowski1, S. Bodenstedt3, L. Maier-Hein4, S. Speidel3, F. Nickel1, F. Mathis-Ullrich2, B.P. Müller-Stich1, M. Wagner1
1Heidelberg University, Department for General-, Visceral- and Transplant Surgery, Heidelberg, 2Karlsruhe Institute for Technology, Institute for Anthropometrics and Robotics, Health Robotics and Automation Lab, Karlsruhe, 3National Center for Tumor Diseases partner site Dresden, Department for Translational Surgical Oncology, Dresden, 4German Cancer Research Center, Department for Computer-Assisted Medical Interventions, Heidelberg, Germany
Aims: Artificial Intelligence and machine learning can help surgeons automate endoscopic video analysis, perform skill assessments, and enable cognitive robotics. However, to effectively use video data for machine learning, large quantities of high-quality annotations are necessary. As the time of expert surgeons as annotators is limited, other alternatives must be explored. We investigated whether machine learning performance varies between unprocessed multi-rater annotations by medical students including rating uncertainty compared to majority-voting annotations with and without denoising.
Methods: The annotation-dataset consisted of n = 188 images from laparoscopic cholecystectomy videos. The dataset was annotated independently by five medical students using the Semantic Segmentation Editor following a standardized annotation protocol. Every pixel was assigned to one of the following classes: Gallbladder, Liver, Instrument, Fat, Out-of-image, Other.
Using Python, majority-voting annotations were calculated and denoised by removing artifacts with a size < 1000 pixels. The three datasets (multi-rater, majority-voting with and without denoising) were divided using an 8–1-1 split. Three separate "Ternausnet-16" nets were trained for each dataset, at a training resolution of 512 pixels, for a maximum of 500 epochs using the intersection-over-union (IOU) as the loss function. Training was stopped prematurely if no improvement was recorded over 20 epochs. Students t-test was used to compare results.
Results: The majority-voting datasets performed better than the raw multi-rater annotations with IOUs at 91.811 (denoised) and 81.324 (multi-rater) (p < 0.01). Machine learning trained with denoised data showed a better IOU of 91.811 (p = 0.02) and an average of 18.52 ± 15.25 (artifacts) while the unprocessed dataset showed an average of 21.54 ± 19.25 (artifacts) (p < 0.01) smaller than 1000 pixels over the three nets.
Conclusion: Raw multi-rater annotations including uncertainty information led to more uncertainty in the trained algorithm. Majority-voting showed a consistently better performance compared to raw multi-rater annotations. While the IOU between unprocessed and denoised majority-voting datasets was close, denoised annotations performed better in terms of artifacts and usability in the annotation from the algorithm. Therefore we suggest that majority-voting and despeckling should be performed before training to increase annotation usability for artificial intelligence in surgery.
Robotics & new techniques—basic and technical research
O225—Carbon dioxide load of intra-abdominal insufflation in porcine laparoscopy
Willem van Weteringen1, F. Sterke1, R. Wijnen1, J. Vlot1, J. Dankelman2
1Erasmus MC—Sophia Children's Hospital, University Medical Center Rotterdam, Department of Pediatric Surgery, 2Delft University of Technology, Department of BioMechanical Engineering, The Netherlands
Aims: The insufflation of carbon dioxide (CO2) gas for minimal access surgery leads to peritoneal uptake of CO2 into the blood. This adds onto the physiological metabolic CO2 load, and needs to be ventilated to prevent hypercapnia and acidosis. This study investigated the CO2 load of intra-abdominal gas insufflation during laparoscopy, with the aim of finding an optimum in the applied insufflation pressures.
Methods: Pigs with a targeted weight of 20 kg were mechanically ventilated with a controlled tidal volume of ± 7.5 ml/kg at a positive end-expiratory pressure of 5 cm H2O (3.75 mm Hg). To prevent measurement artefacts due to voluntary breathing a deep neuromuscular blockade was applied. A closed-loop ventilation system was used that adapted the ventilation frequency to maintain an end-tidal CO2 value of 7.0 kPa. This allowed the exhaled volume of CO2 per minute (VCO2) to be used as an indicator of CO2 load at each insufflation pressure. The abdominal cavity was stepwise insufflated using a gas insufflator that maintained a constant insufflation pressure. At each pressure step 10 breaths were recorded. VCO2 was calculated per breath using continuous pressure, flow and capnographic measurements.
Results: A total of 10 female Landrace pigs with a median weight of 20.8 kg (range 18.5 – 22.7 kg) were insufflated with pressures of 0, 3.75, 6, 7.5, 9, 10.5, 12, 13.5 and 15 mm Hg. End-tidal CO2 values throughout all experiments had a median of 7.35 kPa (IQR 7.15 – 7.64). At the baseline insufflation pressure (0 mm Hg) the carbon dioxide load was 155 mL/min (IQR 126 – 168). VCO2 increased with insufflation pressures, reaching a plateau of 200 mL/min (IQR 177 – 217) at approximately 7.5 mm Hg (Fig. 1).
Conclusions: This study shows that when end-tidal CO2 values are kept constant, the expired CO2 volume or VCO2 can be used to investigate the CO2 load that is added by laparoscopic insufflation. Although the CO2 load of laparoscopy is significant when compared to the baseline load, CO2 did not accumulate over time. It can be concluded that CO2 load mainly depends on the management of ventilation more than insufflation.

Robotics & new techniques—basic and technical research
O226—The effect of neuromuscular blockade on surgical workspace in experimental laparoscopy
Frank Sterke, W. van Weteringen, P.A. van der Zee, R.M.H. Wijnen, J. Vlot
Erasmus MC—Sophia Children's Hospital, University Medical Center Rotterdam, Department of Pediatric surgery, The Netherlands
Aims: In open surgery neuromuscular blockade (NMB) is used to increase tissue compliance, enhancing surgical workspace. With the introduction of minimal access surgery the use of NMB has been adopted, however without any evidence on a resulting increase in surgical workspace. Studies on the effect of NMB on surgical workspace have remained inconclusive. This study investigated the effects of NMB and its reversal during repeated insufflation runs on laparoscopic workspace in a porcine model.
Methods: In 20 kg pigs muscle relaxation was applied using rocuronium and managed with monitoring of both train-of-four (TOF) and post-tetanic count (PTC) responses. All subjects were randomly divided into three NMB groups: no NMB (TOF 4/4; PTC 10/10), moderate NMB (TOF 0/4; PTC 10/10) and deep NMB (TOF 0/4; PTC 0/10). During each of four sequential insufflation runs, pressures were increased stepwise up to 15 mm Hg and then decreased to 0 mm Hg. Insufflation runs were repeated four times to distinguish the effect of NMB from the effect of repeated insufflation. After the third insufflation run NMB was reversed using sugammadex. At each pressure step a CT scan was made during an end-expiratory pause, from which the intra-abdominal CO2 gas volume was measured, which was corrected for weight. This.
Results: A total of 28 female Landrace pigs were included, weights ranged from 18.5 to 24.1 kg (median 21.1 kg). There was no significant difference in weight between NMB groups. Created intra-abdominal volume was not affected by the level of NMB, no significant difference was found. The effect of repeated insufflation was profound and kept increasing even after reversal of NMB.
Conclusions: In this porcine laparoscopy model NMB has no significant effect on the created surgical workspace volume. The benefit of NMB in improving surgical conditions in laparoscopy may not be the result of an actual increase in surgical workspace. Repetitive insufflation could increase surgical workspace significantly and deserves further investigation.

Robotics & new techniques—colorectal
O029—Robotic endoscopic cooperative surgery for colorectal tumors: a feasibility study
Nariaki Okamoto1, M. Al-Taher2, P. Mascagni4, A .Garcia Vazquez3, M. Takeuchi3, J. Marescaux3, M. Diana3, B. Dallemagne3
1IRCAD, Research Institute against Digestive Cancer and Colorectal surgery, 2IHU-Strasbourg, Institute of Image-Guided Surgery Surgery, 3IHU-Strasbourg, Institute of Image-Guided Surgery,- France, 4Fondazione Policlinico Universitario A. Gemelli IRCCS, Surgery, Italy
Background: Laparoscopic endoscopic cooperative surgery (LECS) is a promising technique for full-thickness resection of colorectal tumors (LECS-CR). This approach has shown good rates of complete resection and local recurrence, especially for large laterally spreading tumors which are difficult to remove via endoscopy alone. However, it is often difficult to prevent leakage of intestinal content in the peritoneum, causing infections and recurrences. It was hypothesized that robotic assistance could make the procedure easier and decrease intestinal fluid leakage. This preclinical trial aims to assess the feasibility of robotic and endoscopic cooperative surgery for colorectal tumors (RECS-CR).
Methods: LECS-CR was performed in 5 female pigs and RECS-CR was performed in 5 female pigs. With the pig under general anesthesia, a pseudotumor was created using endoscopic rubber band ligation on the posterior, lateral, and upper walls of the colonic mucosa at a distance from the anal verge ranging between 20 and 25 cm. Following confirmation of the tumor location, desired resection margins were marked endoscopically and 2 stay sutures were placed either robotically or laparoscopically. A mucosa-to-submucosa dissection was performed endoscopically along the markings. Complete full-thickness dissection was performed cooperatively. The specimen was withdrawn endoscopically. The colon was closed using a self-fixating running suture. Operating time and complications were recorded. A resection was deemed complete (R0) when mucosal markings were included in the specimen. Leak tests were performed by irrigating the abdominal cavity with 1000 mL of saline and submerging the colon while insufflating. To study potential contaminations from intestinal leakage, the presence of Escherichia coli in the abdominal cavity was measured dipping a test paper.
Results: The median number of colonies of E. coli in the RECS group was significantly lower than in the LECS group (27 ± 30.2 vs. 177.8 ± 78.4 respectively, p < 0.05). Operating time was comparable (78 ± 10.5 vs. 78 ± 21.6 respectively, p = 0.89). Two stenoses occurred in the LECS group. A positive leak test occurred in the RECS group. R0 resection was achieved in all cases.
Conclusion: This study suggests that RECS-CR is feasible and has the potential to reduce intestinal content leakage, thereby preventing postoperative infections.
Robotics & new techniques—colorectal
O110—The medrobotics flex Robot® for transanal surgery
Alberto Arezzo, Edoardo Forcignano', E. Forcignano', G. Lo Secco, G. Pentassuglia, M. Morino
Città della Salute e della Scienza, Department of Surgical Sciences, University of Torino, Italy
Aim: The Flex® Robotic System (Medrobotics) represents a miniaturized endoscopic surgical procedure device that permits to operate surgical maneuvers in areas that are now not attainable by TEM, but presently only by flexible endoscopes, lacking of surgical characteristics, as they miss tissue manipulation. We present our consecutive series with the use of the Flex® Robotic System.
Methods: This is a retrospective analysis of a prospective database created in October 2018. Indications for Flex Robot® were benign rectal lesions judged unsuitable for endoscopic removal or early rectal cancer, suspected invasive or metastatic rectal carcinoma to be treated with palliative intent, located within 20 cm of the anal verge. Briefing and a debriefing meetings at the end of each procedure allowed technology assessment leading to the modification, development and implementation of tools according to the clinical experience. A bipolar Maryland became available after the first cases, the shape of the rectoscope changed and a steerable cannula for suction and irrigation is about to be used in the clinical practice.
Results: Between October 2018 and November 2019, 26 patients with rectal disease underwent transanal local excision by means of Flex Robot®. The median distal distance from the anal verge was 6 cm (range 2–16 cm), the median proximal distance from the anal verge 10 cm (range 4–20 cm). All procedures were performed under general anaesthesia, 16 (61.5%) in supine and 10 (38.5%) in prone position. In 15 cases (57.7%) the procedure consisted of a full-thickness rectal wall excision, while in 11 cases (42.3%) of a submucosal dissection. All full-thickness excisions were completed with a double running suture. The median operating time was 115 min (range 50–360). An inadvertent opening of the peritoneum was observed in 1 (3.8%) case, treated with direct suturing. In 6 (23.1%) case it was necessary to convert to standard TEO procedure (Karl Storz, Tuttlingen, Germany) to complete suturing the defect. The 30-day morbidity rate was 11.5% (3/26): 1 substenosis of the anastomosis, 1 minor bleeding and 1 major bleeding requiring second transanal surgery by means of a TEO platform. The mean length of hospital stay was 3 days (range 1–10).
The mean surface area removed was 21.0 ± 16.0 (range 4–54; median 17.5) cm2. Histological examination of the surgical specimens demonstrated an adenoma in 16 (61.5%) cases, a carcinoma in 8 (30.8%), while in 2 (7.7%) cases no adenoma were detected. Positive resection margins were detected in 15.4% patients overall. No specimen fragmentation occurred. At a minimum follow up of 12 months (range 12–19) one recurrence (1/26) was observed.
Conclusions: Our personal experience confirms the proof that flexible robotic technologies can increase the possibility of difficult dissection inside the gastrointestinal lumen making use of a surgical method primarily based on tissue manipulation, traction and countertraction. Thus, with the due development still needed to increase dexterity of the system, the Medrobotics platform can appreciably extend the number of complete resection in the higher tract of the rectum and above.
Robotics & new techniques—colorectal
O227—Tailored ICG fluorescence-guided lymphadenectomy during robotic colorectal surgery: interim analysis of a prospective observational monocentric study
Domenico Lo Conte1, A. Mellano1, V. Sega1, F. Mento1, T. Staiano2, D. RIbero1, G. Spinoglio1
Aim: Lymph node status is the most important prognostic factor in colorectal cancer. Previous anatomical studies of the lymph-flow pattern from any colorectal segments had revealed a significant anatomical variability. Nevertheless, the extent of lymphadenectomy is still routinely defined on anatomical landmarks.
An intraoperative tool able to objectively highlight the specific lymph-flow, i.e. all lymph nodes connected to the cancer area, might provide the surgeon the possibility to retrieve the patient lymphatic basin enhancing the chance of oncological accuracy. Indocyanine green (ICG) dye injected in the tumor area has been shown to provide this information.
In 2019 we started a prospective observational study (Greenlight Trial) to investigate the use of ICG-tailored lymphadenectomy during robotic colorectal surgery. The principal aim was to define the number of patients in which the fluorescence changed the extension of a standard lymphadenectomy.
Methods: From 4/2019 all consecutive patients who underwent robotic surgery with the with Da Vinci Xi for a colorectal cancer were enrolled. The day before surgery all patients received an endoscopy to inject 6 ml of saline-solution with 3 mg of ICG in the peritumoral submucosal layer (4 injection of 1.5 ml in 4 cardinal points).
Results: Eighty-eight patients (48 males and 40 females) were enrolled. Median age was 67 years. A right hemicolectomy was performed in 31 cases, a splenic flexure resection in 4, a left hemicolectomy in 20, an anterior rectal resection in 33 (7 PME and 26 TME). Twenty-two patients with rectal cancers received preoperative chemoradiation. Median operative time was 305 min. Median hospital stay was 5 days. No major complication nor 30-days postoperative death were registered. No ICG-injection related complication occurred. The median number of harvested lymph nodes was 18 (range 13–35). ICG-fluorescent lymphnodes were observed in 97,7% (86/88). Fluorescent extraregional lymph nodes were found in 34 patients (38,6%), (10/31 in right hemicolecomys, 3/20 in left hemicolectomys and 21/33 in anterior rectal resections). The mean number of retrieved extraregional fluorescent lymph nodes was 4 (range 1–8).
Conclusion: Robotic fluorescence-guided lymphadenectomy for colorectal cancer is feasible and safe changing the extent of lymphadenectomy in 38% of patient.
ROBOTICS & NEW TECHNIQUES—Colorectal
O228—Laparoscopic three-dimensional vs 2D ventral rectopexy for rectocele and rectal prolapse correction: a prospective, randomized, single center study
Alexander Khitaryan1, Anastasiya Golovina1, A Alibekov1, S. Kovalev1, N. Romodan1, I. Chepurnaya2, D. Shimchenko2
1Private Healthcare Institution "RGD-Medicine" of Rostov-on-Don city, Surgical Department, 2Rostov-on-Don State Medical University, Russia
Aims: To compare proximate and remote results of 3D and conventional 2D laparoscopic interventions in terms of efficacy and safety in treatment of symptomatic rectocele and rectal prolapse.
Methods: A 35–70 years old female patients with stage 3 rectocele (3–4 POP-Q grade) and/or full-thickness rectal prolapse were included into a prospective randomized comparative study in parallel groups conducted in single Colorectal unit. The patients were randomly assigned to 3D or 2D-laparoscopy groups and then underwent laparoscopic ventral rectopexy. The primary outcome was objective cure rate of pelvic prolapse. Secondary outcomes included obstructive defecation and incontinence symptoms according to Wexner and Cleveland Clinic scales, and satisfaction according to Patient Global Impression of Improvement questionnaire. Operative times, intraoperative blood loss, length of hospital stay, postop pain severity, urinary incontinence, as well as surgical and mesh complications were also assessed. The specific point of interest in this study was also surgeon’s tiredness after the operation assessed with Profile of Mood States questionnaire. Unpaired and paired data were analyzed by the Mann–Whitney and Wilcoxon tests, respectively, to compare ordinal and non-normally distributed continuous variables. Chi-square or Fischer exact test were used for categorical data. Two-tailed p < 0.05 was considered significant.
Results: Sixty-one patients were included in this study. Surveillance period was no less than 12 months after surgery. At one year follow-up the cure rate for rectocele and rectal prolapse was 100% with both approaches. There were no significant differences between groups in secondary outcomes with the exception of operative time and blood loss. Overall surgical time was imperceptible shorter in 3D-group due to more precise pelvic spaces dissection. And intraoperative blood loss was a little less in 3D-laparoscopy group. Significant differences were found in point of surgeon ‘s tiredness after the operation, where the results were much better in 3D-group.
Conclusion(s): Three-dimensional laparoscopy provides outcomes comparable to conventional laparoscopy in terms of efficacy and safety. 3D-laparoscopy allows better vision in narrow pelvic spaces, more accurate dissection, along with a lower risk of injury to anatomical structures and small blood vessels, without significantly increasing the economic costs.
Robotics & new techniques
O240—Early clinical adoption of a flexible robotic endoscope for rectal lesions: evolving technology, perfectible results
Edoardo Forcignano', A. Arezzo, M. Morino
Città della Salute e della Scienza, Department of Surgical Sciences, University of Torino, Italy
Aim: The Flex® Robotic System (Medrobotics, Raynham, MA, USA) represents a miniaturized endoscopic device that permits surgical manoeuvres in areas that are presently not reached by Transanal Endoscopic Microsurgery (TEM).
Methods: We collected prospectively all consecutive cases of local excisions performed by the Flex® Robotic System. Indications were benign rectal lesions judged unsuitable for endoscopic removal, within 20 cm of the anal verge. Debriefing meetings after each procedure allowed technology assessment leading to the modification, development and implementation of tools according to the clinical experience. We analyzed the data in terms of safety and efficacy of treatment.
Results: Between October 2018 and February 2020, 26 patients were included. In 14 cases we performed a full-thickness excision, in 12 patients a submucosal dissection. The median operating time was 115 min (range 45–360). In 6 patients (23.1%), we converted to standard TEO (Karl Storz, Tuttlingen, Germany) to complete the procedure. The 30-day morbidity rate was 11.5% (3/26). Positive resection margins were detected in 15.4% (4/26) patients. At a minimum follow up of 12 months two recurrences (2/26) were observed.
Conclusions: Our personal experience confirms that although flexible robotic technologies might increase the possibility of the overall performance of difficult dissection inside the gastrointestinal lumen, the current state of the art of technology development is still insufficient to overcome the limits of current rigid platforms. Further improvements are mandatory in order to allow a surgical method primarily based on tissue manipulation, traction and counter traction.
Robotics & new techniques—education
O097—Comparative analysis of surgical gesture sequence patterns by means of unsupervised machine learning
Cristians Gonzalez1, F. Ouhmich2, J. Verde2, S. Perretta1, B. Dallemagne3, D. Mutter1, J. Marescaux3
1CHRU Nouvel Hopital Civil—Hospitaux Universitaires de Strasbourg, General, Digestive and Endocrine Surgery,2Institute of Image-Guided Surgery,3Research Institute against Cancer of the Digestive System, France
Introduction Surgeries are complex processes in which the sequences of actions and gestures are highly variable and therefore difficult to quantify and/or standardize. The recent development of machine learning and big data analytics has opened the opportunity for structured analysis of surgical videos in order to identify potential gesture patterns and discriminate the possible impact they have on surgical workflow and outcomes.
Methods and procedures: With the aim of analyzing the effect of the different sequence of gestures patterns on operative time and the occurrence of unexpected intraoperative events, 80 unedited videos of low and high complexity laparoscopic surgeries performed at the Institute of Image-Guided Surgery (Strasbourg, France) were evaluated. Following a semi-automatic temporal segmentation of phases, steps and actions, a metric based on the string representation of the surgical sequences of each video was built. The clusters of gesture patterns were determined using an unsupervised machine learning method derived from Levenshtein's distance. Permutations, shifts, re-entries and omissions were considered to calculate the distances and similarities among surgeries.
Results: We included 40 videos of both laparoscopic cholecystectomy (LC) and laparoscopic Roux-in-Y gastric bypass (LRYGB). There were identified 10 phases and 30 steps in LC and 11 phases and 45 steps in LRYGP. The results of unsupervised machine learning processing distinguished 4 different gesture patterns during LC and 3 during LRYGB. Dissimilarities between LC clusters were mainly originated by omissions and re-entries, while in LRYGB they were caused by shifts and permutations. Correlation matrices showed greater entropy for LRYGB compared to LC. Mean operating times in LC were discreetly variable, while in LRYGB was markedly different. The occurrence of unexpected events was randomly observed in all clusters (p = 0.8403). The clusters C4 in LC and B3 in LRYGB showed a more standardized gesture pattern and duration. Lastly, 3 LC videos and 4 LRYGB videos could not be attributed to any of the clusters and were classified as outlier cases.
Conclusion: By means of unsupervised machine learning it is possible to identify clusters of different surgical gesture patterns between apparently similar surgical procedures. These clusters reflect the subtle variations present in each surgery and allow the effective identification of outlier cases. This technique permits the objective and scalable analysis of large video databases for educational, auditing and performance feedback purposes.
Robotics & new techniques—education
O098—Robotic assisted minimally invasive esophagectomy (RAMIE) training curriculum, a worldwide Delphi consensus
Hans Friedrich Fuchs1, J. Collins2, B. Babic1, C. DuCoin3, O.Meireles4, P.P. Grimminger5, M.Read6, A. Abbas7, R. Sallum8, B. Müller-Stich9, D. Perez10, M. Biebl11, J.H. Egberts12, R. van Hillegersberg13, C.J. Bruns1
1University of Cologne, Surgery, Germany. 2University College London, Urology, United Kingdom. 3University of South Florida, Surgery, USA. 4Harvard Medical School MGH, Surgery, USA. 5University of Mainz, Surgery, Germany. 6University of Melbourne, Surgery, Australia. 7Temple University, Surgery, USA. 8University of Sao Paulo, Surgery, Brazil. 9University of Heidelberg, Surgery, Germany. 10University of Hamburg, Surgery, Germany. 11Charite Berlin, Surgery, Germany. 12University of Schleswig Holstein Kiel, Surgery, Germany. 13UMC Utrecht, Surgery, The Netherlands
Introduction: Evidence suggests that structured training programs for robotic procedures can ensure a safe standard of skill acquisition prior to independent practice. Although robotic assisted minimally invasive esophagectomy (RAMIE) is technically demanding, no consensus on curriculum for training on the RAMIE procedure exists. The aim of this study is to determine essential steps required for a structured training curriculum of RAMIE using the Delphi consensus methodology.
Methods: Fourteen worldwide RAMIE experts (EAES, SAGES, ESDE, or UGIRA members) were asked to participate in this study. The consensus process consisted of structured meetings with the expert panel, and three Delphi questionnaire rounds starting December 2019. A list of items required for training RAMIE was created. Items required included, but were not limited to, virtual reality simulation, wet-lab training, proctoring, and continued monitoring and education. Items were rated by the experts and consensus was defined as achieving Cronbach alpha ≥ 0.70. Items were considered as fundamental when ≥ 80% of experts reached a consensus.
Results: All Delphi rounds were completed by 12–14 (86–100%) of the 14 invited experts. Following three rounds of a 49-item questionnaire, 40 items reached consensus for a training curriculum of RAMIE.
Figure 1 Selected answers of the delphi consensus process
Conclusion: A consensus among worldwide RAMIE experts on essential items required for a RAMIE training curriculum is presented. The identified items can serve as directive principles and core standards for creating a comprehensive training program for RAMIE.
RRobotics & new techniques—education
O099—A randomised crossover study of the effects of real-time surgical workflows on performance scores and cognitive demands during simulated operations
Jasmine Winter Beatty, S. Chidambaram, S. Erridge, P.O. Ortega, H.S. Sidhu, M. Souvatzi, M.H. Sodergren, J.M. Kinross, S. Purkayastha
Imperial College London, Surgery and Cancer, United Kingdom
Aims: To determine how operative workflows, displayed on auxiliary screens during a computer simulated operation, are perceived as adjuncts to learning and if use affects performance or cognitive demands.
Methods: Inclusion criteria included basic knowledge of laparoscopic cholecystectomy and relevant anatomy, demonstrated by successful completion of accredited e-learning modules (TouchSurgeryTM). Participants who had previously performed a laparoscopic cholecystectomy were excluded. Technical competency was standardised through completion of Lapmentor simulator basic skills modules (SimbionixTM).
The workflow was prepared by expert surgeons, using GoSurgeryTM software (TouchSurgeryTM), and detailed operative instructions to perform a level-1 laparoscopic cholecystectomy (example Figs. 1 and 2).
Participants performed three simulated laparoscopic cholecystectomies. They were randomly allocated to complete the procedure without (control group) or with the workflows (GoSurgery group), and then crossover twice to the opposite arm.
After each simulation, participants completed a validated task load index for surgical procedures (SURG-TLX), measuring perceived cognitive demands.
After the study, participants completed feedback questionnaires including Likert-style statements based upon Kirkpatrick’s training evaluation.
Screen-recordings of simulated operations were blindly assessed by expert surgeons, using validated scores: Objective Structured Assessment of Technical Skill (OSATS) and laparoscopic cholecystectomy specific performance and error scores (Eubanks et al., 1999).
Statistical significance was defined with a p-value < 0.05.
Results: Forty-eight medical students, doctors and surgical trainees were recruited.
Significant improvements were noted with repeat attempts for OSATS, Error scores and time taken (p < 0.01), but not for performance scores (p = 0.272).
At the final attempt, the GoSurgery group performed marginally better than controls, with median OSATS (19 v. 17, p = 0.989), performance (72 v. 71.5, p = 0.730) and error scores (17 v. 22, p = 0.268) favouring the intervention group, although not significantly.
Surg-TLX scores were reduced when using workflows but this only reached statistical significance for the Temporary-Demands domain (Mental-Demands p = 0.353, Task-Complexity p = 0.502, Situational-Stress p = 0.223, Distractions p = 0.126, Temporal-Demands p = 0.037).
Procedure time was significantly longer in the GoSurgery group (20.5 v. 14 min, p = 0.033).
More than 90% of participants agreed that workflows were enjoyable, user-friendly and aided learning.
Conclusion: Real-time operative workflows are perceived as useful adjuncts to learning in simulated environments and may diminish cognitive burdens. Workflows improved operative performance scores and diminished errors, although not significantly. Further research is needed to determine effects at different training levels on a larger scale, with possible applications in formal surgical training programmes.


Robotics & new techniques—education
O116—The use of augmented reality (AR) in modern surgical education
Mohamed Fayez Hassouna1, Federico Espinola2, M Chand3
1National University of Asuncion, Division of Surgery and Interventional Sciences, United Kingdom. 2National University of Asuncion, Chair of Surgery and Semiotics, Paraguay. 3University College Hospital, Colorectal Service, United Kingdom
Introduction: Anatomy is the cornerstone of surgery. A confident grasp over applied surgical anatomy is essential for a surgeon to understand the target structures that need to be resected/repaired/removed and/or replaced, along with preserving the surrounding anatomy and preventing collateral damage. It is important that surgery should be taught as a combination of understanding applied anatomical variations, followed by manual techniques mastering. This allows for safe and appropriate surgical planning, as well as improves the surgeons ‘ breadth of experience and knowledge, and their ability to deal with the unexpected situations that may happen intraoperatively. We suggest that more attention should be paid to this aspect of training, that will offer a kind of extra gear in term of enthusiasm and ability to learn the basic methodology of navigating surgical practice.
Patient-specific three-dimensional modelling is a novel tool that helps us understand surgery and also helps teach. Surgical strategy can be discussed using MRI / CT scans, but this can be difficult to translate two-dimensional images into a surgical approach and also difficult to teach students. The use of AR allows to better visualize the anatomy in relation to the surrounding structures in addition to better approximating the size and shape of the abdominal organs. Our goal is to present an affordable solution that can be used in low-income countries also in educational centers.
Augmented Reality: Augmented reality offers computer-processed imaging data in real-time through devoted blended methods using both software and hardware. The main concept is to superimpose a computer-generated (CG) images on a real-world imagery. We argue that we can take advantage of native support in modern personal phones, instead of video projectors, tablet PCs, headsets, or computers, and display them to functionally create the illusion of AR.
Applications: Augmented reality proved to be a great functional educational tool for medical students and junior surgeons. As regional anatomy has a much value than systematic anatomy in the practice of surgery, AR can use real-time patient-specific anatomical information to allow accurate reconstructions to better demonstrate the anatomy in relation to surrounding structures.
Augmented reality can beneficially be used within pre, intra, and post operative applications. It helps in the pre-surgical planning, decision making, and the performance of live surgeries. AR gives the ability to navigate patient ‘s organs and structures. Allows to analyse the surgery, separate in steps, and practice different approaches. Enables to cut virtually and perform a virtual surgery before the surgery itself.
Furthermore, AR can be used as a surgical objective assessment tool to evaluate how successful the surgery was. For example, AR can determine if the surgical objectives were completely accomplished or not, if all the tumour was safely resected, if any iatrogenic injuries happened, and so on. In case the surgical goals have not been, AR can possibly plan the next procedure more effectively.
Surgical Simulation: Once we have realistic models of the patient's anatomy, it is possible to create VR simulations of surgical procedures. This would allow to practice countless times and also to have several examples of anatomies for training.
Thanks to 3D printing technology, we can create realistic models from the patient. Providing this tactile feedback to the models, adds a layer of realism which would improve the learning experience. Moreover, creating models for each patient before and after surgery to create a model collection for surgical training and minimally invasive procedures practicing.
Conclusion: It is possible to create realistic patient-specific AR models without proprietary software and to be visualized using low-cost mobile devices. Patient-specific anatomic modelling has several applications in surgery, from surgical planning to education, further improvement in deep-learning mediated automatic segmentation and clinical certification will allow this technology to be a future standard of care. This advance would allow a rapid implementation of using AR in surgical practice and education at a global level. Augmented Reality in surgery promises to be a feasible way to improve the learning curves and surgical outcomes. However, further advances in artificial intelligence and image methods are still required to expand its capabilities, along with more research is necessary to validate its clinical use in surgical centres.
Robotics & new techniques—education
O207—The feasibility of using Design Thinking for creating surgical hands-on training models
Chi-Chuan Yeh1, G.Y. Chen1, W.Y. Yeh2, H.L. Lin3, C.N. Chen1
1National Taiwan University Hospital and National Taiwan University College of Medicine, Department of Medical Education, Department of Surgery, 2National Taiwan University Hospital and National Taiwan University College of Medicine, School and Graduate Institute of Physical Therapy, 3National Taiwan University Hospital and National Taiwan University College of Medicine, Department of Nursing, Taiwan
Traditional ways for learning surgical procedures are through reading surgical atlas, observing surgical demonstrations, watching videos, or searching online resources. Hands-on training rooted from Experiential Learning can provide practices for operations, promote teamwork and communication, and cultivate creativity to train surgical teams. Design thinking is human-centered and considered as a framework for solving complex problems. The purpose of this study was to test the feasibility of using Design Thinking for creating surgical hands-on training models.
We have conducted two ‘Constructing Hands-on Models for Surgical Training Workshop’ between December 2020 to February 2021. 24 participants created 9 prototypes of hands-on models. Their self-evaluation of ‘I know and can use Design think for creating surgical models’ increased significantly (2.50 ± 0.87, 4.21 ± 0.58, p = 0.00, Likert scale 1–5). They satisfied this section adopting Design thinking concept (4.54 ± 0.50) and agreed that this workshop can help them for establishing new way of thinking (4.33 ± 0.89) and enhance their clinical work (4.48 ± 0.50). Overall, they credited this workshop very much (94.10 ± 4.65, scale 1–100). In conclusion, using Design Thinking for creating surgical hands-on training models was feasible. Implementation in large scales should be further evaluated.
Robotics & new techniques—flexible surgery
O236—The Medrobotics Platform Flex Robot ® for transanal surgery
Alberto Arezzo, Edoardo Forcignanò
University of Turin, Department of Surgical Sciences, Italy
Aim: The Flex® Robotic System (Medrobotics) represents a miniaturized endoscopic surgical procedure device that permits to operate surgical maneuvers in areas that are now not attainable by TEM, but presently only by flexible endoscopes, lacking of surgical characteristics, as they miss tissue manipulation. We present our consecutive series with the use of the Flex® Robotic System.
Methods: This is a retrospective analysis of a prospective database created in October 2018. Indications for Flex Robot® were benign rectal lesions judged unsuitable for endoscopic removal or early rectal cancer, suspected invasive or metastatic rectal carcinoma to be treated with palliative intent, located within 20 cm of the anal verge. Briefing and a debriefing meetings at the end of each procedure allowed technology assessment leading to the modification, development and implementation of tools according to the clinical experience. A bipolar Maryland became available after the first cases, the shape of the rectoscope changed and a steerable cannula for suction and irrigation is about to be used in the clinical practice.
Results: Between October 2018 and November 2019, 26 patients with rectal disease underwent transanal local excision by means of Flex Robot®. The median distal distance from the anal verge was 6 cm (range 2–16 cm), the median proximal distance from the anal verge 10 cm (range 4–20 cm). All procedures were performed under general anaesthesia, 16 (61.5%) in supine and 10 (38.5%) in prone position. In 15 cases (57.7%) the procedure consisted of a full-thickness rectal wall excision, while in 11 cases (42.3%) of a submucosal dissection. All full-thickness excisions were completed with a double running suture. The median operating time was 115 min (range 50–360). An inadvertent opening of the peritoneum was observed in 1 (3.8%) case, treated with direct suturing. In 6 (23.1%) case it was necessary to convert to standard TEO procedure (Karl Storz, Tuttlingen, Germany) to complete suturing the defect. The 30-day morbidity rate was 11.5% (3/26): 1 substenosis of the anastomosis, 1 minor bleeding and 1 major bleeding requiring second transanal surgery by means of a TEO platform. The mean length of hospital stay was 3 days (range 1–10).
The mean surface area removed was 21.0 ± 16.0 (range 4–54; median 17.5) cm2. Histological examination of the surgical specimens demonstrated an adenoma in 16 (61.5%) cases, a carcinoma in 8 (30.8%), while in 2 (7.7%) cases no adenoma were detected. Positive resection margins were detected in 15.4% patients overall. No specimen fragmentation occurred. At a minimum follow up of 12 months (range 12–19) one recurrence (1/26) was observed.
Conclusions: Our personal experience confirms the proof that flexible robotic technologies can increase the possibility of difficult dissection inside the gastrointestinal lumen making use of a surgical method primarily based on tissue manipulation, traction and countertraction. Thus, with the due development still needed to increase dexterity of the system, the Medrobotics platform can appreciably extend the number of complete resection in the higher tract of the rectum and above.
Robotics & new techniques—flexible surgery
O238—Evaluating surgeons’ experiences of virtual clinics during the COVID-19 pandemic
Alexander Bush1, M.Madanur2, M. Goh3, S. Sinha1
1Torbay Hospital, South Devon Upper GI Unit, 2QEH Woolwich, General Surgery, 3Derriford Hospital, Colorectal Surgery, United Kingdom
Aim: The COVID-19 pandemic changed the way that people across the globe conduct all aspects of their lives. One important method to limit virus spread is to limit face-to-face interaction where possible. This has been particularly important in hospitals where there is a duty to protect vulnerable patients from contracting the virus whilst also providing care for those afflicted with it. Virtual clinics have been one important way that surgical services have adapted. Virtual clinics are those in which the clinician and patient are in different locations and communicate using a telephone or video call. This study aimed to evaluate surgeons’ experiences conducting virtual clinics in the UK. This UK-wide survey of surgeons aimed to evaluate how virtual clinics are being used during the pandemic and what clinicians experiences of conducting these clinics has been.
Methods: An electronic 10 point questionnaire containing both multiple choice and open-ended questions was prepared and distributed via e-mail to surgeons across the UK. Results were tabulated.
Results: 93 consultant surgeons from 26 NHS trusts and a range of specialties responded. 95.7% had conducted virtual clinics. Telephone was used by 78.5% with the remainder using video also. 51.5% of clinicians defaulted to virtual consultations for all patients. 69.1% of respondents reported reduced patients not attending appointments although 2.1% reported an increase. 40.2% of consultants reported involving their trainees in clinics. 58.8% reported predominantly positive feedback from patients with only 1% reported predominantly negative feedback. 90.7% did not conduct patient satisfaction surveys. 87.6% of clinicians intended to continue to conduct clinics virtually in the future and 62.9% reported active initiatives within their trusts to do so.
Conclusions: Virtual clinics have been widely used during the COVID-19 pandemic. They are popular with clinicians and appear likely to continue to be widely used in the future. Most surgeons did not conduct patient feedback. Correlation of these results with patient satisfaction surveys will be important to ensure that this clinic modality is acceptable to patients. Evaluation of patient outcomes will also be important to complete our understanding.
Robotics & new techniques—flexible surgery
O239—Animal validation of a new single-incision device for flexible-single-incision-surgery
José Noguera, Alba Gomez, L. Garcia, L. Castro, J. Garcia, M. Taboada
Complejo Hospitalario Universitario A Coruña, General Surgery, Spain
Background: A new single-port device (FSIS-Flexible-Single-Incision-Surgery) is presented (Fig. 1). This new platform has three working channels, two for rigid instruments and one for the flexible endoscope. The channel for flexible instruments offers a pneumatic sealing to avoid the air’s leak of the cavity (abdomen, rectum, vagina). In this study the preclinical data are shown testing the feasibility and safety for laparo-endoscopic instruments.
Methods: Experimental evaluation of feasibility and safety in two stages. In the first stage a working channel with pneumatic sealing was tested in simulators to use a flexible endoscope. In the second stage (animal model) the single incision device that makes possible to use laparoscopic instruments and flexible endoscopes was tested. The measured variables were: time of the procedure, CO2 employed, adverse intraoperative events, grip’s losing, losing of pneumatic sealing, feasibility and safety of the procedure for the surgeon. The surgical procedures were a trans-abdominal surgical histerectomy and a transanal endoscopic submucosal resection in four quadrants (Fig. 2).
Results: The hysterectomy and double adnexectomy was done with a median time of 7.1 min. The transanal procedure with a minimal four-quadrants resection (ESD more than 1 cm2) was done with a median time of 8.4 min. The median of the CO2 consumption was 32.5 L, with slight differences between transabdominal and transanal differences. Only in one case (16.6%) the surgeon had problems with the abdominal navigation of the endoscope that was easily solved. The grip’s lose wasn’t a major problem. The median size of the skin incision in the abdominal access was 5.4 cm. The median surgeon’ score for the feasibility was 10 and for the safety was 9.6.
Conclusions: The surgeons considered that the use of the device was very feasible and safe. The FSIS-device is a universal platform for Single-Incision-Surgery for surgeons and gastroenterologists and for abdominal, rectal and vaginal access.


Robotics & new techniques—liver
O030—Laparoscopic and robotic radical surgery for liver alveolar echinococcosis (echinococcus multilocularis)
Natalia Elizarova, M. Efanov, R. Alikhanov, I. Kazakov, A. Vankovich, O. Melekhina, Y. Kulezneva, V. Tsvirkun
Loginov Moscow Clinical Scientific Center, HPB Surgery Department Russia
Aim: To estimate the immediate and long-term results of laparoscopic and robotic radical surgery for liver alveolar echinococcosis (AE).
Methods: There were 6 patients with AE undergone radical surgery using minimal invasive technologies from 2013 to 2019 at the Hepatopancreatobiliary Surgery Department of the Loginov Moscow Clinical Scientific Centre. A laparoscopic liver resection was performed in 5 cases, and in one case a Da’Vinci robotic complex was used. Masses were found in the right lobe of the liver, mainly 7–8 liver segments, in all cases. The average lesion size was 60 ± 20 mm.
Results: A half of patients (3 patients, 50%) with P2 stage of AE were operated on, another 3 cases had P1 stage. In two cases, in patients with P2 stage, a right hemihepatectomy was performed, in 2 cases a segmentectomy 8 with atypical resection segment 4 was performed, in one case a posterior sectionectomy was performed, in one case the intervention was performed with atypical resection of 6 segments. The average age of the patients was 55 years (27–79), three women and three men (1: 1). In 2 cases patients had previous abdominal surgery. The average size of the lesion was 60 ± 20 cm. The mean operation time was 344 ± 141 min, the average blood loss was 350 ± 333 ml. An intermittent Pringle maneuver was used in 4 cases (66,7%) with average ligament clamping time 19 min and with pauses of at least 5 min. Complications were observed in one case (16,7%), type II according to Clavien-Dindo, represented by dynamic intestinal obstruction, which developed on the 6th day of the postoperative period and was resolved conservatively. Mean hospital stay was 9 ± 3. In all cases, there was histological confirmation of the diagnosis by the results of a study of a remote lesion. The average observation time was 45,4 months (10–84).
Conclusion: Laparoscopic and robotic liver resections in the radical treatment of AE can be safe and feasible in the early stages (P1-2H0M0), provided they are performed in a specialized hospital with sufficient technical equipment and an experienced surgeon.
Robotics & new techniques—liver
O031—What is IDEAL in robot-assisted liver surgery? A systematic review of techniques and technologies
Martin Wagner1, J.M. Brandenburg1, M. Haselbeck-Koebler1, P. Probst1, E. Kalkum1, F. Nickel1, L. Maier-Hein2, A. Mehrabi1, B.P. Müller-Stich1
1Heidelberg University Hospital, General, Visceral and Transplantation Surgery, Germany. 2German Cancer Research Center, General, Visceral and Transplantation Surgery, Germany
Robot-assisted liver surgery (RALS) has advanced the field of minimally invasive liver surgery due to advantages such as 3D-visualization and enhanced precision. To evaluate its impact on clinical practice, the aim of the present study was to systematically review the literature on RALS regarding applications, techniques and new technologies.
A systematic literature search in PubMed, Web of Science and Cochrane was conducted for articles dealing with RALS. Operative technique, resection size, resected tumor type as well as use of new technologies were extracted. Then each article was classified and analyzed according to its current state in the innovation process with the use of the Balliol Classification of IDEAL (Idea, Development, Exploration, Assessment, Long-term study), which has been developed to assess and improve the concept of developing surgical innovations.
A total of 9759 published records were identified. After the screening, 171 original articles on RALS were included in the analysis. The first article reporting clinical RALS was published in 2003. Between 2003 and 2015 a total of 50 articles were published and from 2016 up to May 2020 120 articles. On average 28,6 patients per article were treated with RALS.
The articles could be assigned to the IDEAL-stages as follows: 1 (n = 35), 2a (n = 58), 2b (n = 60), 3 (n = 7) and 4 (n = 3). RALS was not described separately in 8 articles.
A description of the RALS workflow including used instruments was performed in 108 articles. Use of intraoperative ultrasound was reported in 74 articles. Intraoperative use of new technologies was described in 19 articles including indocyanine green fluorescence (n = 16), augmented reality with 3D-planning (n = 2) and the application of a new surgical instrument (Laparoscopic Saline-Coupled Bipolar Sealer; n = 1).
The IDEAL-concept is a valuable classification-tool in surgical research studies illustrating the development of the field. As shown by our analysis, there has been rapid progress in RALS in the last five years. We found an overall maturity level of RALS between the stages 2a and 2b. However, this innovation process is far from being completed. Randomized controlled trials (stage 3) have to be performed. Overall RALS offers the opportunity to integrate new technologies and presents a contact point for decision support systems.
Robotics & new techniques—liver
O032—Short-term outcomes of da Vinci Xi versus Si robotic systems for minor hepatectomies
Giorgio Bianchi1, N. de'Angelis1, R. Memeo2
Ospedale Regionale “F. Miulli”, 1Minimally Invasive and Robotic Digestive Surgery Unit, 2Hepato-Biliary and Pancreatic Surgical Unit, Italy
Aims: The present study aims to compare the da Vinci Xi vs. Si surgical systems in regard to short-term outcomes of minor hepatectomies.
Methods: Consecutive patients operated on between 2013 and 2020 in two referral centers were selected if underwent robotic elective minor hepatectomy (< 3 consecutive segments) for primarily resectable benign or malignant lesions. Operative, postoperative, and cost outcomes were compared between the two groups by univariate and multivariate analyses.
Results: Eighty-nine patients were selected (64 in the Si system vs. 25 in the Xi system group). Wedge resection was the most commonly performed procedure (49.4%). The Si system group showed a significantly greater total incisional length (+ 9.71 mm; p < 0.0001) related to the use of a higher number of robotic/laparoscopic ports. Pedicle clamping was more frequent in patients operated on by the Xi system (80% vs. 21.9%; p < 0.0001) but without group differences in ischemia duration when clamping. A significantly shorter ICU stay (-1.06 days; p = 0.013) and time to flatus (-0.71 days; p = 0.019) were observed for patients operated on by the Xi system, whereas no differences were found in postoperative complications. The Si system was associated with higher instruments costs but the two systems had similar operative room costs, hospital stay costs, and total costs.
Conclusion: The da Vinci Xi system represents a definite technological advancement with a potential clinical relevance, although further studies are needed to clearly detect the clinical impact of the use of this robotic platform in liver surgery.
Robotics & new techniques—liver
O033—Role of Robotic Surgery in the management of benign hepatobiliary diseases
Eli Kakiashvili
Galilee medical center, general surgery, Israel
Background: recently robotic surgery has emerged as one of the most promising surgical advances. Despite its worldwide acceptance in many different surgical specialties, the use of robotic assistance in the field of hepatobiliary (HBP) surgery remains relatively unexplored.
Our study presents single institution's initial experience of robotic assisted surgery for treatment of benign hepatobiliary pathologies.
Methods: A retrospective analysis of a prospectively maintained database on clinical outcomes was performed for 32 consecutive patients that underwent robotic assisted surgery for benign HBP disease at Rambam Medical Center during 2013–2016.
Results: There were 32 robotic assisted surgical procedures performed for benign HBP pathologies during the study period. There were 4 anatomical robotic liver resections for symptomatic hemangiomas, 9 cases of giant liver cyst, 5 robotic assisted surgery for type I choledochal cyst, 3 case of benign (iatrogenic) common bile duct (CBD) stricture, 5 cases of robotic (CBD) exploration due to large intra choledochal stones and 6 cases of cholecystectomy for cholelithiasis. The median postoperative hospital stays for all procedures were 3.5 days (range 1–6 days). General morbidity (minor) was 2%. There was no mortality in our series.
Conclusion: Robotic surgery is feasible and can be safely performed in patients with different benign HBP pathologies. Further evaluation with clinical trials is required to validate it's real benefits.
Robotics & new techniques—pancreas
O046—Robot-assisted pancreatoduodenectomy with the da Vinci Xi: a case-matched cost-analysis versus open approach
Gregorio Di Franco1, Matteo Palmeri1, V. Lorenzoni2, P. Palmeri1, N. Furbetta1, S. Guadagni1, D Gianardi1, M. Bianchini1, R. Guelfi1, L.E. Pollina3, F. Melfi4, D. Mamone5, C. Milli6, G. Di Candio1, G. Turchetti7, L. Morelli1
1University of Pisa, General Surgery, Department of Translational Research and New Technologies in Medicine and Surgery, 2Scuola Superiore Sant'Anna, Institute of Management, 3University Hospital of Pisa, Second Division of Surgical Pathology, 4University Hospital of Pisa, Multidisciplinary Center of Robotic Surgery, 5University Hospital of Pisa, Pharmaceutical Unit: Medical Device Management, 6University Hospital of Pisa, Board of Directors, 7Scuola Superiore Sant'Anna, Institute of Management, Italy
Aims: Robot-assisted pancreaticoduodenectomy (RPD) has shown some advantages over open pancreaticoduodenectomy (OPD) but few studies have reported a cost analysis between the two techniques. We performed a structured cost-analysis comparing PD performed with the use of the da Vinci Xi, and the traditional open approach, in a high-volume multidisciplinary robotic center and considering health direct costs associated with the intervention and the short-term post-operative course.
Methods: Twenty RPD and 194 OPD performed between January 2011 to December 2020 by the same operator were retrospectively analyzed. Two comparable groups of 20 patients (Xi-RPD-group) and 40 patients (OPD-group) were obtained matching 1:2 the RPD-group with the OPD-group. Perioperative data and overall costs (OC), including overall variable costs (OVC) and fixed costs, were compared. OVC comprised items related to disposable instruments used within each intervention (consumable costs, CCs), operating room personnel (personnel costs, PCs), and hospital stay costs (HCs) which included costs associated to the length of stay, both ICU and general ward, costs of reoperation, and post-operative procedures.
Results: No difference was reported in mean operative time: 428 min for Xi-RPD-group versus 404 min for OPD, p = 0.212. The median overall length of hospital stay was significantly lower in the Xi-RPD-group: 10 days versus 16 days, p = 0.001. In the Xi-RPD-group, consumable costs were significantly higher (€6,149.2 versus €1,267.4, p < 0.001), while hospital stay costs were significantly lower: €5,231.6 versus €8,180 (p = 0.001). No significant differences were found in terms of OVCs: €13,483.4 in Xi-RPD-group versus €11,879.8 in OPD-group (p = 0.076).
Conclusions: Robot-assisted surgery is more expensive because of higher acquisition and maintenance costs. However, although RPD is associated to higher material costs, the advantages of the robotic system associated to lower hospital stay costs, and the no different personnel costs due thanks to the similar operative time with respect to the OPD, make the overall variable costs of the two techniques no longer different. The higher costs of advanced technology may be offset by clinical advantages, particularly within a high-volume multidisciplinary center for robot-assisted surgery and for pancreatic surgery.
Robotics & new techniques—pancreass
O047—Robotic central pancreatectomy with pancreaticogastrostomy for solid pseudopapillary tumor
Chiara Filippini, M. De Pastena, S. Paiella, M. Ramera, A. Balduzzi, E. Bannone, G. Deiro, G. Montagnini, E. Andreotti, A. Esposito, R Salvia
University of Verona, General and Pancreatic Surgery, Italy
Aims: Central pancreatectomy is a viable option for the removal of benign and low-grade malignant tumor located at the body and neck of the pancreas which are not suitable for enucleation. This video describes the technique of robotic centra pancreatectomy with pancreaticogastrostomy.
Methods: A 24-year-old woman with no previous medical history was incidentally diagnosed with a solid tumor of the body of the pancreas. MRI demonstrated a 2-cm mass with upstream duct dilatation and EUS-guided FNA confirmed the suspicion of solid pseudopapillary tumor (SPT).
Results: Four robotic trocars were placed along the transumbilical line (two on the left, one supraumbilical and one on the right flank, spaced at least 8 cm from each other). Two additional assistant laparoscopic trocars were placed caudal to the previous ones. Robotic central pancreatectomy was performed with a stapler section of the cephalad pancreatic margin. After wide mobilization of the distal pancreatic stump and a running, single-layered pancreaticogastrostomy was performed. The postoperative course was uneventful although a biochemical leak was detected. The patient was discharge on day 11 and surgical drains were removed on day 7 and 19. Pathology confirms the diagnosis of SPT with negative margin and no lymph nodes involved (N0/11).
Conclusions: In the setting of a high-volume center, central pancreatectomy is associated with good short-term surgical morbidity and it can be achieved with minimally invasive approach. Pancreaticogastrostomy is a valid reconstruction option and avoids an additional anastomosis.
Robotics & new techniques—pancreass
O048—Minimally-invasive pancreatic reconstruction. Description of different surgical techniques with the robotic approach
Elena Andreotti, M. De Pastena, S. Paiella, M. Ramera, A. Balduzzi, E. Bannone, G. Deiro, G. Montagnini, C. Filippini, A. Esposito, R. Salvia
University of Verona, General and Pancreatic Surgery, Italy
Minimally invasive pancreatic resections are technically demanding but rapidly increasing in popularity. In contrast to minimally-invasive distal pancreatectomy, minimally-invasive pancreatoduodenectomy (MIPD) or central pancreatectomy (MICP) have not yet obtained wide acceptance, probably due to technical challenges, especially regarding the pancreatic anastomosis.
The study describes and demonstrates all steps of different pancreatic anastomoses during MIPD, including the modified Blumgart pancreaticojejunostomy (mB-PJ) (1), Cattel-Warren duct-to-mucosa pancreaticojejunostomy (CW-PJ) with an externalized main pancreatic stent (2), and pancreogastrostomy (PG) (3).
The Da Vinci Surgical System® platform (Intuitive Surgical Xi, Sunnyvale, CA) was used to perform the MIPD and MICP. Pneumoperitoneum was created by the open technique at the umbilicus with 12 mmHg CO2 pressure. Four robotic trocars 8 mm were placed along the transumbilical line (two on the left, one supraumbilical and one on the right flank, spaced at least 8 cm from each other). Two additional assistant laparoscopic trocars were placed for the ultrasonic scalpel (Harmonic ACE + ®; Johnson & Johnson Medical, Ethicon, Somerville, NJ, USA or Thunderbeat®; Olympus Corporation, Tokyo, Japan), scissors, clip applicator, suction, and the eventual transection of the pancreas by stapler device. The 30-degree optical scope and the robotic instruments, such as a grasper, bipolar coagulation, Vessel Sealer and monopolar scissors, were routinely used.
An end-to-side mB-PJ is performed with large needles barbed trans-pancreatic sutures (3/0 Ti-Cron™; Medtronic) and 4 to 6 duct-to-mucosa sutures using absorbable multifilament (5/0 GORE-TEX®; GORE) combined with a 12 cm, 6 Fr internal stent.
A end-to-side CW-PJ is performed in 2-layer using interrupted non-absorbable suture for posterior and anterior row (3/0 Ti-Cron™; Medtronic) and four non-absorbable stitch are placed to complete duct-to-mucosa (5/0 GORE-TEX®; GORE). A 6 or 8 Fr PankreaPlus® polyvinyl catheter (Peter Pflug- beil Gmbh Medizinische Instrumente) is inserted into the pancreatic duct and externalized through a stab incision in the anterior abdominal wall. The pancreatic stent was secured with absorbable suture (4/0 Vicryl Rapide, Covidien).
A PG is performed with the mobilization of pancreatic remnant for 2 cm to allow invagination into the stomach. A 2-cm vertical incision on the posterior wall was performed and two self-retaining monofilament running sutures (3/0 V Loc 180, Covidien) were placed.
The minimally-invasive pancreatic reconstruction is safe, feasible, and reproducible. The described techniques for the pancreatic anastomosis are well standardized, but should still validated in large.
Multicenter studies. This complex operation should be performed at high-volume centers where surgeons have extensive experience in both open pancreatic surgery and advanced laparoscopic gastro-intestinal surgery.
Robotics & new techniques—pancreass
O049—Robotic wirsung-jejunal anastomosis for pancreatoduodenectomy: a feasible and safe approach
Chiara Montanari, Graziano Pernazza, G. Pernazza, R. Mancini, T. Picconi, L. Ioni, G. Galotti, P. Campagna
AO San Giovanni Addolorata Ospital/Robotic General Surgery Unit, Surgery, Italy
Aim: An increasing body of literature is supporting the safety of robotic pancreaticoduodenectomy (PD) with some clear advantages in the reconstructive phase of the procedure. The purpose of this study is to compare the overall complication rates, including post-operative pancreatic fistula (POPF), between Wirsung-jejunal anastomosis performed with robotic and open approach.
Methods: From July 2017 to March 2021, 15 patients received minimally invasive robot-assisted PD treatment for various lesions (pancreatic cancer, bile duct cancer and Vater’s papilla cancer).
In all patients a Whipple procedure with duct-to-mucosa pancreatico-jejunal anastomosis was performed. An end-to-side anastomotic method was used (Fig. 1): firstly the posterior wall of anastomotic stoma was finished with single-layer continuos running suture; then the main pancreatic duct and the jejunum mucous membrane incision were discontinuosly sutured after the placement of an endoluminal stenting tube; finally the anterior wall of anastomotic stoma was completed with another single-layer continous running suture. The 33.3% (5/15) of cases was converted to open procedure due to intra-operative assessment of locally advanced disease (invasion of the superior mesenteric vessels).
Results: A grade B POPF was observed in the 30% (3/10) of patients who underwent total robotic PD. Furthermore in the same group the 50% (5/10) had grade II complications according to Clavien-Dindo Classification (intra-abdominal abscess or anemization), treated with antibiotic therapy and blood transfusions; the 20% (2/10) had CD grade III complications (like gastric bleeding and peri-epatic collection), with necessity of endoscopic or radiological intervention.
The 40% (2/5) of the open group had CD grade III complications (gastric bleeding): one patient underwent to an endoscopic intervention and the other to a surgical one. The 60% (3/5) was treated by medical therapy alone (CD grade II).
The incidence of POPF and other post-operative morbidities was not higher in robotic assisted Wirsung-jejunal anastomosis performed in robotic PD.
Conclusions: Although these data are representative of a small reality, robotic duct-to-mucosa anastomosis is a feasable technique of pancreatico-jejunostomy that leads to good post-operative outcomes.

Robotics & new techniques—pancreass
O050—Results of robot- assisted pancreatic surgery. Single-centre Russian experience
Andrey Kriger1, Ayrat Kaldarov1, S. Berelavichus1, D. Gorin1, V. Panteleev1, M .Raevskaya2, P. Davidenko3, A. Kaldarov1
Vishnevsky Centr of Surgery, 1Abdominal, 2Intensive care Unit (ICU), 3Rentgenology & Radiology, Russia
Background: Robotic technology is a fast developing part of contemporary surgery. It became possible to solve a number of technical difficulties during surgeries after the appearance of modern robotic systems. However, there are insufficient studies about feasibility of the robotic pancreatic resections. We present our single-centre experience in robot-assisted pancreatic surgery.
Aim: To estimate the feasibility of using robotic complex in pancreatic surgery.
Material and methods: This is a retrospective study of 124 patients with pancreatic tumors surgically treated by robotic approach (RA) for the last ten years. There were 95 (76,6%) females and 29 males (23,4%), mean age was 49 (range: 18–73). Performed surgeries are: 17 pancreaticoduodenectomy, 69 distal pancreatectomies, 44 tumor enucleations, 9 median pancreatectomies and 2 total pancreatectomies.
Results: The time of procedure depended on the volume of the surgery: it was 400 (360;505) min for pancreaticoduodenectomy, distal pancreatectomy – 210 (178;250) min. Estimated blood loss in cases of pancreaticoduodenectomy was 200 (150;500) ml, distal pancreatectomy – 100 (50;300) ml, tumor enucleations and median pancreatectomies – minimal blood loss. Conversion rate was 8 cases: 2 in pancreaticoduodenectomy, 4 in distal pancreatectomy and 2 in tumor enucleation. The average postoperative length of stay was 15 ± 9 days and depended on the volume of operations. The highest was in cases of RA pancreaticoduodenectomy – 16 (14;25), the lowest – after organ – preserving interventions-12 (8;15). Postoperative complications occurred in 48 cases: there were 40 pancreatic fistulas; in 8 cases postpancreatectomy hemorrhage occurred.
Conclusion: Initial indications for robot- assisted procedures are malignant and premalignant pancreatic tumors without invasion into magisterial vessels benign tumors less than 6 cm diameter. With learning curve indications for robot-assisted pancreatic surgery can and have to be extended. Due to minimal tissue trauma, the postoperative period in RA is smoother and more comfortable for patients.
Robotics & new techniques—pancreass
O051—Transition from open and laparoscopic to robotic pancreaticoduodenectomy in a UK tertiary referral centre
Tamara Gall, J. Long
Imperial College, Surgery and Cancer, United Kingdom
Introduction: Pancreaticoduodenectomy is performed using an open technique (OPD) as the gold standard. An increase in those performed laparoscopically (LPD) and robotically (RPD) are now reported. We compared the short-term outcomes of RPD cases with LPD and OPD.
Methods: A retrospective review of a prospectively collected database was undertaken of our first consecutive RPD, our first LPD and consecutive OPD cases. Those requiring venous and/or arterial resection were excluded.
Results: RPD (n = 25) had longer operating times (451.9 ± 92.2 mins) than LPD (n = 41) (338.2 ± 55.6 min) and OPD (n = 37) (309.6 ± 81.0 min, p < 0.0001). On subgroup analysis, after 20 cases, RPD operating time was comparable to OPD (p = 0.414). Estimated blood loss and transfusion requirement was less after RPD and LPD compared to OPD (p = 0.012 and p < 0.0001 respectively). No RPD cases required conversion to open operation compared to 24.4% of LPD. Morbidity was comparable. 90-day mortality was seen in 0.97% of the total cohort. Length of hospital stay (LOS) was shorter for RPD compared to both LPD (p = 0.030) and OPD (p = 0.002).
Conclusion: RPD is safe to perform with comparable outcomes to LPD and OPD. Further evidence is provided that a randomised controlled trial for PD techniques is required.
Robotics & new techniques—solid organs
O052—Robot-assisted transaxillary surgery for thyroid cancer using a gasless unilateral approach: a safe and effective alternative to conventional surgery
Piermarco Papini, A. De Palma, L. Rossi, M. Ginesini, A. Ripolli, L. Fregoli, G. Materazzi
Azienda Ospedaliero Universitaria Pisana, Department of Surgery, Italy
Aim: It’s reported the experience of a series of more than 200 thyroid cancers treated using RATTS. This is, to our knowledge, the largest European series of thyroid cancer treated by RATTS.
Method: A retrospective analysis was conducted on 242 patients (pts) with findings of thyroid cancer in final histologic examination from October 2012 to September 2020. The preoperative assessment was neck ultrasonography, FNAB and laboratory thyroid profile. Median follow-up was 30 months (1–88 months) and 21 pts were lost. Follow-up was carried measuring thyroglobulin (Tg) levels and ultrasonography. All the procedures were completed successfully using Da Vinci® SI or XI surgical robot systems with a unilateral three arms gasless technique.
Results: There were 239 women and 3 men with a mean age of 35.9 years. The preoperative diagnosis on the nodules was: 41 benign (17%), 115 indeterminate(48%) and 86 malignant(35%). Mean thyroid volume was 17.9 ml. A total thyroidectomy was performed in 128 pts, a lobectomy in 114 pts. Mean operative time was 95 ± 27 min for total thyroidectomy and 76 ± 24 min for lobectomy. According to the European consensus for thyroid cancer management a 28 patients underwent a completion thyroidectomy. The histologic examination revealed 173 papillary carcinoma, 47 microcarcinoma(< 10 mm), 14 NIFTP and 8 follicular carcinoma. The papillary carcinoma variant was classic in 81 cases, follicular in 66 cases and more aggressive variants in 26 patients. According to American Thyroid Association’s risk classification 182 pts were classified within the low risk group, while 60 pts within intermediate risk group. The mean nodule diameter was 20 mm(2–54 mm). Complication rate was 5.4%, including transient hypoparathyroidism in 3 pts (1.2%), transient vocal fold palsy in 3 pts(1.2%), 2 postoperative hematoma (0.82%) and 2 postoperative seroma (0.82%). All pts are free from disease; serum Tg at last followup in patients who did not perform RAI was 0.77 ± 0.81 ng/ml According to final histology 90 pts underwent RAI. Mean radioiodine dose used for ablation was 38 ± 19.6 mCi and the mean value of serum Tg after RAI was 0.61 ± 1.1 ng/ml.
Conclusions: RATTS is a feasible, safe, and cosmetic surgical alternative for selected patients with low- and intermediate-risk thyroid cancer. When performed by surgeons experienced in robotic techniques for thyroid surgery It is possible to achieve an effective oncologic result.
Robotics & new techniques—technology
O079—Safe combination use of automatic and manual insufflation in flexible endoscopy: a double blinded randomized animal trial
Ushimaru Yuki 1, Y .Kotaro2, S. Takuro2, T. Koji2, Y. Kazuyoshi2, M. Tomoki2, T. Tsuyoshi2, K. Yukinori2, Y. Makoto2, E Hidetoshi2, D. Yuichiro2, N. Kiyokazu1
Osaka University, 1Department of Next Generation Endoscopic Intervention (Project ENGINE), 2Department of Gastroenterological Surgery, Japan
Background: Optimal visualization has always been essential in performing any type of endoscopic surgery. We have developed an automatic insufflation unit for flexible endoscopy, to provide a constant pressure environment in the gastrointestinal (GI) tract. The safety of automatic GI insufflation, however, has not been shown in detail, especially when manual insufflation is combined. The aim was to evaluate the safety of our new insufflation unit with or w/o safety mechanism (automatic “cut-off” function at maximum pressure) to allow simultaneous use of manual insufflation in large animal experimental settings.
Methods: A double-blinded randomized controlled trial was undertaken on endoscopists without information about the presence of safety mechanism that cut-off excessive insufflation above 20 mmHg. The endoscopists performed endoscopy with automatic insufflation at their “preferrable” pressure between 8 and 15 mmHg, and added additional pressure using manual insufflation when they judged that the visualization was insufficient. The actual GI pressure values displayed on the insufflation unit were blinded to the endoscopists during the study. In group A, endoscopists performed esophageal endoscopic submucosal dissection (ESD) with our unit equipped with a safety mechanism, and Group B performed ESD without the safety system. At the same time, intraluminal GI pressure was continuously monitored. The primary endpoint was to verify whether esophageal ESD was safely performed, and the secondary endpoint was to verify the stabilization of GI pressure during esophageal ESD. A questionnaire survey was conducted after each session.
Results: A total of 79 endoscopists were entered into the randomized control study. There was no significant difference in ESD completion rate (A: 42 / 42 [100%], B: 35 / 37 [94.6%]; p = 0.08). The measured GI pressure was significantly lower in group A than in group B (A: 11.2 ± 4.28 mmHg vs. B: 16.5 ± 7.23 mmHg, p < 0.05). In group B, two pigs died from tension pneumothorax, while not in group A (p = 0.08). Although within the acceptable range, the evaluation was less favorable in Group A in “the expansion of the lumen,” “the ease of aspiration,” and “the reproducibility of visualization.” The results of the questionnaire survey showed no significant differences in any of the items.
Conclusions: This preclinical double-blinded study showed that endoscopic treatment with combined use of automatic and manual insufflation could be performed more safely with the addition of safety mechanism. This safety device did not adversely affect the endoscopist's feeling of use.
Robotics & new techniques—technology
O080—Learning pattern of 2D HD, 3D HD and 4 K HD endovision system on standardized phantom tasks: an ex-vivo randomized study
Hemanga Bhattacharjee1, Harshit Agarwal1, H. Agarwal1, V. Singla1, S. Chaliyadan1, A. Mishra2, S. Suhani1, M. Joshi1, R. Parshad1
All India Institute of Medical Sciences, 1Department of Surgical Disciplines, 2National Drug Dependence Treatment Centre (NDDTC), India
Introduction: Three-dimensional (3D) high-definition (HD) and ultra-high definition (4 K HD) are recent addition over regular high-definition (HD) technology for laparoscopic surgery. The aim of this study was to evaluate the learning pattern of 2D HD, 3D HD and 4 K HD endovision systems on standardized phantom tasks.
Methodology: Forty-five 45 stereo-enabled resident doctors with no experience of independent laparoscopic procedure were enrolled. They were randomly assigned into three groups. Each group performed three validated phantoms tasks in a laparoscopic trainer box using either 2D HD, 3D HD or 4 K HD endovision systems. The tasks performed were precision touch on flat surface (Task 1), Precision touch on un-even surface (Task 2), Surgical knot on rubber tube (Task 3). Each task was repeated 20 times. Outcome data of four consecutive repetitions were pooled to make five blocks. Comparisons of consecutive blocks in terms of execution time and error score were made to see the learning pattern. Presence of significant difference between the blocks were accepted as continuous learning effect while absence were accepted as plateau on learning.
Result: The learning plateau for operating time was achieved in two tasks after third block in 2D HD, one task in 4 K HD after 4th block. There was continuous learning in all tasks with 3D HD, two tasks in 4 K HD and one in 2D HD. 3D HD group was significantly faster in most of the tasks on 5th block (Fig. 1). The error scores were similar between the consecutive blocks in 4 K HD. Plateau on error score was achieved after 2nd block in 2D HD group and 3rd block on 3D HD (Fig. 2). On task 1, 3D HD made more errors, while on other tasks, error scores were comparable between the systems on 5th block.
Conclusion: The 3D HD endovision system has more potential of faster execution of a task, but need more practice to reached similar safety profile. The 4 K HD endovision system reached the safety plateau with minimal repetitions.
Figure 1: Learning pattern on execution time. Task1, Task2, Task3. 2D HD, Two-dimensional high-definition endovision system. 4K HD, Utra definition endovision system. 3D HD, Three-dimensional high-definition endovision system

Figure 2: Learning pattern on error score. Task1, Task2, Task3. 2D HD, Two-dimensional high-definition endovision system. 4K HD, Utra-high definition endovision system. 3D HD, Three-dimensional high-definition endovision system

Robotics & new techniques—technology
O082—Small bowel soft robotic motile enteroscope (SOFTIE)
Hamza Khan, A. Cuschieri
University of Dundee, School of Medicine, United Kingdom
Aims: The project aims to subtitle the current generation of rigid wireless capsule endoscopy (WCE) pills with a narrower segmented soft robot that is capable of active locomotion inside gastrointestinal tract (GIT) after it is swallowed.
Methods: The segmented design and soft consistency together with 8 mm diameter compared to 11 mm WCE capsules (Fig. 1), ensures easy swallowing of the robot. The intrinsic locomotion is provided by unique vibration-induced skid locomotion on mucosa of GIT. Initially the robot is powered by an active tether, but once SOFTIE enters the duodenum, the tether is detached, and the robot continues with its on-board power supply. Linear resonant actuators are used to provide controllable vibrations and are attached in a unique patented manner to the rubber legs, the direction of which can be changed to provide forward, reverse and static active locomotion. CMOS camera and LEDs lighting are currently being developed. After several iterations we chose an intrinsic clockwise locomotion because when placed inside the tubular structure or intestine, the surrounding circular walls impose 360- constraint on the direction of movement possible by SOFTIE, so that it can move in a stable linear fashion forward or reverse depending on the direction of the vibrating legs.
Results: The experiments showed that the average transit rate inside polyvinyl chloride (PVC) tube of similar diameter to that of the small intestine was fast, averaging 15.6 mm/sec. When introduced inside a very floppy nylon sleeve inflated with air, its transit rate is reduced to 5.9 mm/sec, which is the ideal transit speed for robotic endoscopy.
Conclusion: Our experiments confirm that SOFTIE is capable of active intrinsic locomotion and eventually when equipped with imaging and streaming to external console (requiring further R&D), will undergo testing in pigs at a dedicated research veterinary centre.
Figure 1: SOFTIE Preliminart prototypes

Robotics & new techniques—technology
O083—First steps towards predicting the quality of surgical performance and workload in laparoscopy using wearable technology
Juan A. Sánchez-Margallo1, J. Castillo Rabazo2, D. Durán Rey3, I. López-Agudelo2, M.R. González-Portillo2, P.A. Gloor5, F.M. Sánchez-Margallo4
Jesús Usón Minimally Invasive Surgery Centre, 1Bioengineering and Health Technologies Unit, 2TREMIRS Unit, 3Laparoscopy Unit, 4Scientific Direction, 5Massachusetts Institute of Technology, Center for Collective Intelligence, Spain
Aims: To present the first steps and results towards the development of a machine learning algorithm to predict surgical performance and workload during laparoscopic procedures.
Methods: This study was conducted during three laparoscopic training courses in gynecological, upper gastrointestinal and urological procedures. Ovariectomy, gastrotomy, pyloroplasty and prostatectomy procedures were performed. Surgeons wore a smartwatch on their dominant hand with a custom application running on it in order to acquire motion data and heart rate. At the end of each procedure, participants were asked to complete the Surgery Task Load Index (SURG-TLX), a subjective questionnaire to evaluate the surgical workload. Surgical procedures were also rated using the Global Operational Assessment of Laparoscopic Skills (GOALS) method, a tool for objective evaluation of surgical performance. Correlations between the surgeons’ physiological and kinematic parameters, surgical workload and quality of surgical performance were analyzed. In addition, results were compared between groups of surgeons with different levels of experience in laparoscopy and between surgical specialties.
Results: Fifteen laparoscopic surgeons participated in this study, 5 gynecologists, 4 general surgeons and 6 urologists. Gynecological and urological surgeons showed a negative correlation between the level of experience and hand accelerations. In addition, they showed positive correlations between the level of experience and the GOALS score (Fig. 1). Among the novice surgeons, urologists showed better GOALS score than gynecologists (p < 0.05) (Fig. 2). In all of the three surgical specialties, it was observed that reduction in surgical workload was associated with improved GOALS score.
Conclusions: Preliminary results showed that surgical workload is independent of the surgeons' specialty. More experienced surgeons presented less hand accelerations during the use of surgical instruments. In addition, in gynecological and gastrointestinal procedures, reduced surgical workload is associated with improved surgical performance.

Robotics & new techniques—technology
O084—Real-time intraoperative image acquisition in hybrid operating room for adjusting stereotactic navigation accuracy during pelvic surgery
Cristians Gonzalez1, A.D. Urso2, B. Dallemagne3, D. Mutter1
Institute of Image-Guided Surgery (IHU-Strasbourg)—Nouvel Hôpital Civil (Strasbourg Universita Hospital), Image-Guided Surgery, 2Nouvel Hôpital Civil (Strasbourg Universitary Hospital), Digestive and Endocrine Surgery, 3Institute of Research Against Digestive Cancer (IRCAD-France)—Nouvel Hôpital Civil (Strasbourg Universitary Hospital), France
Introduction: Stereotactic navigation systems include a computer system that uses patient images (e.g., CT or MRI) to guide surgeons during the procedure. Conventionally, the acquisition of these images is done preparatorily so they do not always indicate the actual location of either the patient or the lesion during the operation, resulting in navigation accuracy errors. The registration process establishes baseline navigational accuracy. For this reason, the acquisition of real-time intraoperative images prior to registration is a technique that could increase the accuracy of navigation.
Methods and procedures: With the aim of analyzing the effect of real-time intraoperative image acquisition on navigation accuracy during pelvic surgery, we proceeded to compare registration accuracy (expressed as fiducial registration error FRE) and navigation accuracy (expressed as target registration error TRE) without (Arm 1) and with (Arm 2) the use of an intraoperative multi-axis robotic C-arm (ARTIS ZEEGO, Siemens Healthcare GmbH, Germany) in the hybrid operating room. We use the StealthStation S8 optical navigation system (Medtronic, Minneapolis, MN, USA) for navigation.
Results: We include 3 animal models and 1 human specimen. After performing the baseline abdominopelvic scanner with cutaneous fiducials, we performed the navigation planning through the identification of the anatomical landmarks located at the level of the vascular bifurcations in the aorta and iliac arteries. In Arm 1, registration was performed using only the cutaneous fiducials as a reference. In Arm 2, registration was performed using a fusion of the intraoperative dynamic CT acquisition with the baseline scanner. We observed that the registration accuracy was superior in arm 2, both in the animal model and in the human specimen (FRE: 1 ± 0.1 mm vs. 1.95 ± 0.5 mm). Subsequently, surgical navigation was performed in 3 different positions: 0º, 10º and 45º. We identified the anatomical landmarks in each of these positions. Similarly, the accuracy of navigation was superior in arm 2, in both models (TRE: 2 ± 0.7 mm vs. 2.7 ± 1.3 mm).
Conclusions: In our experimental setting, by adding real-time intraoperative image acquisition in the hybrid operating room, it was possible to improve registration accuracy and reduce navigation errors during minimally invasive pelvic surgery.
Robotics & new techniques—technology
O189—Use of humanoid robots and tablets to increase the efficiency of informed consent in Ivor-Lewis esophagectomy—a prospective randomized study
Rabi Datta, Jennifer Eckhoff, J. Toader, D. Mueller, T. Dratsch, C. Kazikci, S. Turanli, J. Peschka, R. Stier, M. Scholz, I. Wahler, B. Babic, W. Schroeder, C. Bruns, H. Fuchs
University of Cologne, Department for General, Visceral, Cancer and Transplant Surgery, Germany
Introduction: Telemedicine includes a variety of novel technologies and is becoming more and more essential in the clinical routine. The term telemedicine relates to the implementation of telecommunication technology in the context of medical care. This includes virtual or robotic assisted patient contact and may lead to remote-controlled surgical operations.
Particularly in times of the SARS-CoV-2 pandemic, there was an urgent need for a reduction of live patient contact while still offering the best possible medical therapy in order to interrupt infection chains.
Preoperative patient counseling is indispensable. In order to make informed consent as effective as possible, it can be useful to provide the patient with additional information using humanoid robots or tablets.
The aim of this study was to investigate how useful preoperative information of patients by a humanoid robot (Pepper) is compared to information with a tablet only.
Methods: The study was performed at the University Hospital of Cologne as part of regular preoperative counseling before esophagectomy with gastric pull-up (Ivor-Lewis). After randomization, patients received an informative talk either with a tablet or the humanoid robot before counseling was performed by the doctor. The information provided was identical in both cases. Patients evaluated their experience with a questionnaire. In addition, patients answered 11 multiple-choice questions in order to measure the information given by the tablet and the robot.
Results: A total of 28 patients (22 male, 6 female; mean age: 65.0, range: 47.0–80.0) participated in the study. Fifteen patients completed informed consent using the tablet, 13 patients using the humanoid robot. There were no significant differences between the informed consent with the tablet or the robot. There was no significant difference in satisfaction regarding informed consent (p = 0.301) and preoperative anxiety (p = 0.649). The knowledge test also showed no significant differences between informed consent using the tablet (mean score: 78.7%) or the robot (mean score: 75.5%) (p = 0.558).
Conclusion: Support of an informative talk using humanoid robots or tablet computers prior to an Ivor-Lewis esophagectomy was very well received in our clinic by patients and staff.
Additional information transfer by humanoid robots and tablets may be possible. Measures do not differ between the two compared machines. New technologies should be more routinely utilized to make informed consent more effective.
Robotics & new techniques—technology
O276—Real-time detection of intestinal perfusion deficits using laparoscopic laser speckle contrast imaging: evaluation in an experimental porcine model
Wido Heeman1, 2, Aurelia Wildeboer1, 3, M. Al-Taher, 4, 8, J.E.M. Calon5, L.P.S. Stassen, 4, M. Diana8, J.P.M. Derikx1, G.M. van Dam6, E.C. Boerma7, N.D. Bouvy4
1Amsterdam UMC, Department of Pediatric Surgery, 2LIMIS Development BV. Leeuwarden, 3Maastricht University, GROW—School for Oncology and Developmental Biology, 4 Maastricht University Medical Center, Department of Surgery, NUTRIM School of Nutrition and Translational Research in Metabolism, 5ZiuZ Visual Intelligence BV, Gorredijk, 6University Medical Centre Groningen,, Department of Surgery, Optical Molecular Imaging, 7Medical Centre Leeuwarden, Department of Intensive Care, The Netherlands.. 8IRCAD, Research Institute against Digestive Cancer, France
Anastomotic leakage (AL) remains one of the most frequently occurring and feared complications in gastrointestinal surgery. In AL, enteric content contaminates the peritoneal cavity and causes high morbidity and mortality rates. Despite evolving surgical techniques and improved perioperative care, the average reported incidence of AL is 10%, which has not significantly declined over the last decades. Although the exact etiology of AL remains a difficult conundrum, adequate anastomotic perfusion has been identified as one of the most important prerequisites for optimal anastomotic healing. Having an accurate indication of the local intestinal perfusion quality can help surgeons to identify the optimal resection site in order to ensure a well perfused anastomosis and reduce AL risk consequently. Currently available clinical methods for the intraoperative assessment of bowel perfusion are mostly based on subjective criteria (e.g. pulsatile bleeding from marginal arteries, serosal color, distribution of fluorescent dyes) which do not always allow for a reliable evaluation. As the ideal perfusion assessment technique has yet to be discovered, this study tested the feasibility and potential of Lapvas-imaging for the assessment of local perfusion during intestinal surgery.
Lapvas-imaging is a contactless and dye-free laparoscopic imaging tool that gives real-time insight into the perfusion state of the imaged tissue using the laser speckle contrast imaging (LSCI) technique. LSCI uses laser light to generate a so-called speckle pattern which changes due to motion of scatterers, or red blood cells in this case. In this study, the Lapvas-imaging system was used to visualize local tissue perfusion and detect intestinal perfusion deficits in an experimental ischemic bowel loop model.
Two large and two small ischemic loops were created from the small intestine of a pig by clipping 4–7 mesenteric arteries at the base of each loop. On each loop, 5 regions of interest (ROI) were marked corresponding to the vascularized (ROI 1&5), presumed marginally viable (ROI 2&4) and central ischemic (ROI 3) regions, respectively. At baseline (before clipping), T = 0 (right after clipping), T = 30 and T = 45, loops were evaluated clinically and by Lapvas-imaging to not only image local perfusion, but also create analyzable 2D perfusion maps. From these maps, average laser speckle perfusion units (LSPU) were calculated for each ROI at each different time-point. Additionally, local capillary lactates (LCL, a validated tissue ischemia reference test) were obtained by puncturing the bowel serosa in the predefined ROIs. These were used to compare with the determined LSPUs (see Fig. 1 for the experimental setup).
Lapvas-imaging was able to achieve real-time visualization of local intestinal perfusion and induced perfusion deficits in all bowel loops (see Fig. 2). By the detection of perfusion deficits, Lapvas-imaging could predict the emergence of clinically relevant regions of intestinal ischemia directly after clipping the mesenteric arteries. Without Lapvas-imaging, these regions could only be seen after 30 min of compromised perfusion. Additionally, our analyses showed that compromised perfusion detected by Lapvas-imaging was accompanied by a rise in LCL, as expected, but only below a critical level of impaired perfusion. This interesting correlation between the LSPU and LCL, suggests the existence of a LSPU cut-off value differentiating (temporary) harmless impaired perfusion from inadequate perfusion leading to irreversible tissue damage.
In conclusion, this study highlights the significant potential of laparoscopic laser speckle perfusion imaging to enable a better prediction of ischemic complications during surgery, thereby facilitating better informed surgical-decision making when performing restorative intestinal resections.


Solid organs—adrenal
O120—Open and laparoscopic surgery for adrenocortical carcinoma
Christos Parianos1, C. Aggeli1, N. Nasiri-Ansari2, G. Kyriakopoulos2, K. Pateas1, T. Choreutaki3, E. Kassi2, G.N. Zografos1
1General Hospital of Athens 'G.Gennimatas', 3rd surgical department, 2Medical School, National and Kapodistrian University of Athens, Department of Biological Chemistry, 3General Hospital of Athens, Department of Pathology, Greece
Objective: Laparoscopic adrenalectomy has rapidly replaced open adrenalectomy as the procedure of choice for benign adrenal tumors but is still controversial in cases with high suspicion or evidence of malignancy. Adrenocortical carcinoma (ACC) is a rare but very aggressive endocrine malignancy with poor 5-year survival rates. The aim of this study was to evaluate the short and long-term results of laparoscopic and open surgery in adrenocortical carcinoma in a single surgical unit.
Methods: A retrospective analysis of patients with adrenal tumors was conducted. From May 1997 to July 2020, 822 adrenalectomies were performed on 806 patients. Of these 49 had primary malignant cortical neoplasia. They were 29 women and 20 men aged from 19 to 77 years old (mean age 55.5 years).The main clinical symptoms were hormone related while no other symptoms such as abdominal or flank pain and fatigue were observed.The diagnosis of ACC was confirmed histologically by Weiss score > 3, with a range 4–8. The mitotic count ranged from 2 to 28 mitoses per 50 high power fields. Of note, among the 49 ACCs 7 were oncocytic. Patients were staged according to the ENSAT staging system; 3 cases were classified as stage I, 30 as stage II, 14 as stage III and 2 as stage IV.The median size of ACCs was 9 cm ( 3.5-22 cm) and the median weight 127gr (18-1400gr).Tumors were located in the left adrenal gland in 28 patients and in the right adrenal gland in 21. In our cohort no cases of bilateral ACC, or hereditary syndrome were identified.
Results: All the operations, open or laparoscopic, were performed with the patient in the lateral decubitus position. Therefore, there was no need to change the position of the patient in the event of a conversion to an open operation. A transperitoneal lateral approach was used to perform laparoscopic adrenalectomy. The adrenal gland was never grasped to avoid troublesome bleeding or tumor disruption. Thirty-two surgeries were open adrenalectomies, 14 laparoscopic and 3 other laparoscopic surgeries were converted to open surgery. Additional organs (kidney, spleen) were resected in 11 operations. There was no surgical mortality. Median hospital stay was significantly longer in the open compared to laparoscopic surgery group (median 7 compared to 3 days respectively) Survival was significantly higher in patients with stage I–II as compared to patients with stage III–IV ACC (62 ± 8.7 months vs 31 ± 12.1 months, p = 0.02), as expected. Twenty-six patients were alive 1 to 96 months after the first diagnosis. Sixteen patients have died of their disease 1 to 36 months after diagnosis. Seven patients were lost to follow up. The 1-year survival was 70.3% and 5-year survival was 18.9%.
Conclusions: Adrenocortical carcinoma is a rare and very aggressive endocrine malignancy. The most important clinical factors that determine long-term prognosis of ACC are the disease stage at diagnosis and the completeness of surgical resection.
Key words: laparoscopic surgery, adrenocortical carcinoma, open surgery.
References:
1.Kostiainen, I., et al., Adrenocortical carcinoma: presentation and outcome of a contemporary patient series. Endocrine,2019. 65(1): p. 166–174.
2.Mete, O., et al., Immunohistochemical Biomarkers of Adrenal Cortical Neoplasms. Endocr Pathol. 2018.29(2): p. 137–149.
3.Zlatibor, L., et al., Prognostic significance of immunohistochemical markers in adrenocortical carcinoma. Acta Chir Belg,2018. 120(1): p. 23–29.


Solid organs—adrenal
O152—Validity and results of laparoscopic partial adrenalectomy
Igor Kurganov, Dmitry Bogdanov, S..I Emelyanov, M.Sh Mamistvalov
A.I. Yevdokimov Moscow State University of Medicine and Dentistry, Chair of Endoscopic Surgery, Russia
Aim of the study: To investigate the results of laparoscopic partial adrenalectomy (LPA) compared with laparoscopic adrenalectomy (LA) and to define clinical situations when LPA is valid.
Materials and methods: The results of surgeries in 103 patients with benign adrenal tumors. Study group comprised of 36 patients who underwent LPA (aldosteroma—15, incidentaloma—7, corticosteroma—6, nodular cortical hyperplasia—3, adrenal cyst—3, pheochromocytoma—2). 67 patients of the control group (corticosteroma—19, aldosteroma—14, incidentaloma—11, pheochromocytoma—11, nodular cortical hyperplasia—8, adrenal cyst—4) underwent LA. In 5 patients (13,9%) of the study group LPA was performed for bilateral adrenal tumors and in 4 patients (11,1%)—for the lesion of the single adrenal gland after previous contralateral adrenalectomy. Mean tumor size in the study group was 3,1 ± 1,4 cm, in the control group—3,7 ± 1,2 cm (p < 0,05).
Results: LPA was accompanied with significant augmentation of the time of surgery (91,3 ± 13,6 vs 67,2 ± 11,1 min; p < 0,05). Complication rate (5,6% vs 7,5%, p > 0,05), intraoperative blood loss (92 ± 57 vs 84 ± 46 ml; p > 0,05), time of patients activation (7,0 ± 2,9 vs 7,3 ± 2,2 h; p > 0,05), demand for analgesics (19,7 ± 6,1 vs 21,2 ± 8,7 h; p > 0,05) and hospital stay (6,5 ± 0,5 vs 5,9 ± 0,9 days; p > 0,05) did not show significant different between the two comparison groups. In 88,9% of patients LPA of the single or both adrenal glands allowed avoiding the necessity of postoperative steroid therapy. In a number of cases LPA minimized the risk of adjacent organs and vessels injuries due to remoteness of tumor mobilization line. No recurrences in two groups were revealed. Having analyzed we defined the rationale for organ-preserving procedure are bilateral tumors in 5 cases (13,9%), lesion of the single adrenal in 4 (11,1%), small adrenal tumors and cysts with marked capsule in 19 (52,8%), technical difficulties and risk of vessel injury in LA in 8 (22,2%).
Conclusion: LPA is the safe and effective surgical option that is reasonable in patients with bilateral benign adrenal tumors, unilateral benign small adrenal tumors and cysts, technical difficulties and risk of vessel injuries when performing LA.
Solid organs—adrenal
O153—Cancer risk in adrenalectomy: are adrenal lesions equal or more than 4 cm in diameter a contraindication for laparoscopy?
Diletta Corallino, A. Balla, M. Ortenzi, L. Palmieri, F. Meoli, M. Guerrieri, A.M. Paganini
Sapienza University of Rome, Department of General Surgery and Surgical Specialties "Paride Stefanini", Italy
Aims: Adrenal lesions size equal less than 4 cm is considered by some as a positive cut-off limit to set the indication for minimally invasive surgery, due to a supposedly lower risk of malignancy. Aim of this study is to report the risk of cancer for adrenal lesions measuring 4 cm or more in diameter, assessed as benign at preoperative workup (primary outcome), and to evaluate the feasibility, safety and short-term results of laparoscopic adrenalectomy (LA) in these cases (secondary outcome).
Methods: From January 1994 to February 2019, 579 patients underwent adrenalectomy. Fifty patients with a preoperative diagnosis of primary adrenal cancer or metastases were excluded. The remaining 529 patients were included and divided in five subgroups based on adrenal lesion size at definitive histology: group A, 4–5.9 cm (137 patients); group B, 6–7.9 cm (64 patients); group C, 8–9.9 cm (13 patients); group D, ≥ 10 cm (11 patients); group E, < 4 cm (304 patients). Each group was further divided based on diagnosis of benign or malignant lesions at definitive histology.
Results: Four (2.9%) malignant lesions were observed in group A, five (7.8%) in group B, two (15.4%) in Groups C and D (18.2%) and 13 (4.3%) in Group E. Comparing the cancer risk among the groups, no statistically significant differences were observed. Operative time increased with increasing lesion size. However, no statistically significant differences were observed between benign and malignant lesions in each group comparing operative time, conversion and complication rates, postoperative hospital stay and mortality rate.
Conclusions: Adrenal lesions measuring 4 cm or more in diameter are not a contraindication for LA neither in terms of cancer risk nor of conversion and morbidity rates, even if the operative time increases with increasing adrenal lesion diameter. Further prospective studies with a larger number of patients are required to draw definitive conclusions.
Solid organs—thyroid
O272—Multidisciplinary management in blunt splenic traumas: changing strategy, improving outcomes
Annamaria Di Bella, G. Alemanno, D. Perini, R. De Vincenti, A. Bruscino, C. Bergamini, V. Iacopini, Maltinti, P. Prosperi
Careggi University Hospital, Emergency Surgery Unit, Italy
Aim: The management of blunt splenic injuries has significantly changed in recent years. Considering the immunological function of the spleen and the high risk of post-splenectomy infections, the current trend is to preserve the organ whenever a wait-and-see attitude is possible, adopting a Non-Operative Management (NOM). Aim of this study is to evaluate if a Trauma Team (TT) multidisciplinary assessment can improve the decision-making process and, thus, the outcomes of patients with splenic injuries.
Materials and methods: This is a non-randomized single-center retrospective data collection on a consecutive series of splenic trauma patients who accessed the Shock Room of Careggi University Hospital, Florence, in the 20 months prior to the official establishment of the TT (preTT group) and in the following 20 months (postTT group). Exclusion criteria were age < 18 years old and trauma patients who died in Shock Room.
Results: In the study period, total splenic traumas were 174, 75 (43,1%) in the preTT group and 99 (56,9%) in the postTT group. The mean age was 54,9 (+ 21,9) years. A significant increase in NOMs procedures was registered in the postTT group (65,7% vs 49,3%; p = 0,03). Dividing the patients according to AAST (American Association for the Surgery of Trauma) staging, a significant decrease in number of surgeries was observed in grades 3 (p = 0,049) and 4 (p = 0,045) in the postTT group (Fig. 1). Considering only hemodynamically stable patients, there was a significant decrease of splenectomies in postTT group (46,8% vs 18,3%; p = 0,000,239). The mean number of hospitalization days resulted significantly lower in patients who underwent NOM than in the ones who underwent surgical operation (respectively 11,9–12,6 vs 15,4–15,9; p = 0,03).
Conclusions: The introduction of the TT at Careggi University Hospital has improved the management of splenic traumas, significantly reducing the number of surgical operations and the length of hospitalization in case of NOM. A complete alignment with the WSES (World Society of Emergency Surgery) guidelines recommendations was obtained. For these reasons, the TT multidisciplinary management seems to be the best approach for patients with blunt splenic injuries.
Solid organs—thyroid
O273—Laparoscopic splenectomy—experience of the last 5 years
Florin Graur1, A. Radu2, E. Mois1, F. Zaharie1, F. Luminita1, S Domnitei2, I. Vlad2, N. Al Hajjar1
1Regional Institute of Gastroenterology and Hepatology; University of Medicine and Pharmacy "Iuliu Hatieganu", Surgery, 2Regional Institute of Gastroenterology and Hepatology "O. Fodor" Cluj-Napoca, Romania, Surgery, Romania
Since 1992, when the first laparoscopic splenectomy was performed, surgeons worldwide adopted this approach for a series of spleen pathologies, such as immune thrombocytopenia, making it a “gold standard” in elective spleen surgery. Depending on a number of factors, the surgeon’s experience, the malignant or benign aspect of a tumour, the size of the spleen, the laparoscopic splenectomy becomes more and more the preferred approach.
We have analyzed retrospectively a number of 29 laparoscopic splenectomies which were performed in the last 5 years in our Institute. The primary endpoint was the analysis of indication. Our study group included 17 women (58.6%) and 12 men (41.3%), with an average age of 32 (6–68).
As to be expected, hematological disease was a major indication for splenectomy, with 20.6% of these having been performed for hereditary spherocytosis, 13.7% for immune thrombocytopenia, 10.3% for lymphoma, 6.8% for autoimmune hemolytic anemia and 3.4% for plasmacytoma. The rest of the indications for laparoscopic splenectomy included splenic cysts, also confirmed by the anatomopathological results, splenic infarction, aneurysmal malformation of the splenic artery, splenic hamartoma and splenic metastasis from renal cell carcinoma. The average operative time was 116 min.
All these laparoscopic splenectomies were safely conducted, with a successful extraction of the spleen regardless of its size, making laparoscopy the preferred approach when it comes to hematological pathologies. The general advantages of laparoscopic procedures apply in our cases as well, lesser postoperative pain so lower analgesia requirement, faster healing, better aesthetic results which is an important aspect considering the patient's young ages, earlier mobilization.
Solid organs—thyroid
O274—Outcomes of laparoscopic splenectomy for treatment of splenomegaly: a systematic review and meta-analysis
Maria Rita Rodriguez-Luna1, C. Balague2, S. Fernandez-Ananin2, R. Vilallonga3, E. Targarona Soler2
1IRCAD, Research, France. 2Hospital de la Santa Creu I Sant Pau, Gastrointestinal and Hematological Surgical Unit, Service of General and Digestive Surgery, 3Vall d’Hebron University Hospital, Endocrine, Metabolic and Bariatric Unit, Center of Excellence for the EAC-BC, Spain
Objectives: To review the evidence regarding the outcomes of laparoscopic techniques in cases of splenomegaly.
Background: Endoscopic approaches such as laparoscopic, hand-assisted laparoscopic, and robotic surgery are commonly used for splenectomy, but the advantages in cases of splenomegaly are controversial.
Review methods: We conducted a systematic review using PRISMA guidelines. PubMed/MEDLINE, ScienceDirect, Scopus, Cochrane Library, and Web of Science were searched up to February 2020.
Results: Nineteen studies were included for meta-analysis. In relation to laparoscopic splenectomy (LS) versus opensplenectomy (OS), 12 studies revealed a significant reduction in length of hospital stay (LOS) of 3.3 days (p < 0.01) in the LS subgroup. Operative time was higher by 44.4 min (p\0.01) in the LS group. Blood loss was higher in OS 146.2 cc (p = < 0.01). No differences were found regarding morbimortality. The global conversion rate was 19.56%. Five studies compared LS and hand-assisted laparosocpic splenectomy (HALS), but no differences were observed in LOS, blood loss, or complications. HALS had a significantly reduced conversion rate (p < 0.01). In two studies that compared HALS and OS (n = 66), HALS showed a decrease in LOS of 4.5 days (p < 0.01) and increase of 44 min in operative time (p < 0.01), while OS had a significantly higher blood loss of 448 cc (p = 0.01). No differences were found in the complication rate.
Conclusion: LS is a safe approach for splenomegaly, with clear clinical benefits. HALS has a lower conversion rate.Higher-quality confirmatory trials with standardized splenomegaly grading are needed before definitive recommendations can be provided.
Prospero registration number: CRD42019125251.
Solid organs—thyroid
O275—How to deal with complications during laparoscopic splenectomy
Slavko Matic, D Knezevic, N Grubor, I Pavlovic, B Tadic, M Reljic
Clinical Centre of Serbia, Clinic for Digestive Surgery, HPB Surgery, Serbia
Laparosopic splenectomy, first reported by Delaitre et al. 30 years ago continues to depict a surgical challenge, and main reasons for this include rich vascularization and the anatomical position of the organ, thin capsule and fragile parenchymal structure, juxtaposition to surrounding hollow or other organs and frequently present splenomegaly and/or coagulopathic disorders.
Complications could be described as intraoperative and postoperative. Most common intraoperative complication is bleeding, either from ruptured spleen or from splenic vessels and in many cases leads to conversion to an open procedure. Other important intraoperative complications include injury to the splenic flexure, the stomach or to the pancreas. Postoperative complications include bleeding, collections or abscesses, thrombosis of the splenoportal axis and many more.
During a 15-years period we performed laparoscopic splenectomy in 109 patients for several haematological disorders (ITP and various haemolytic anaemias) and other benign disorders of the spleen, including splenic cysts and benign tumours. We encountered bleeding in 9 operated patients, 3 of which had to be converted to an open procedure. We also noted several postoperative complications, which we categorised according to Dindo-Clavien classification. Two patients died during a postoperative course, both due to uncontrollable sepsis after overwhelming immedicable thrombocytopenia.
Careful patient selection with special awareness to those with splenomegaly, meticulous surgical preparation, selecting the most appropriate haemostatic technique, low threshold for conversion to an open procedure and special apprehension for complications during the postoperative course with an appropriate patient medication, continue to be cornerstones of success in patients treated with laparoscopic splenectomy.
Solid organs—thyroid
O053—TOETVA—a study of 69 cases of thyroid surgeries by transoral endoscopic thyroidectomy—vestibular approach (TOETVA) technique with focus on safety
Narendra Lohokare, Aditi N. Lohokare
Siddhakala Hospital, General & Endoscopic Surgery, India
Objective: TransOral Endoscopic Thyroidectomy—Vestibular Approach (TOETVA), an alternative surgical technique for thyroid surgery is gaining widespread popularity.
TOETVA has definite advantages as an endoscopic procedure.
This series aims to study safety & Advantages based on following criteria.
Ease of surgical dissection,
Postoperative pain,
Postoperative Scar and cosmesis,
Intraoperative blood loss,
Occurrence of complications.
Postoperative recovery.
Methods: Total of 69 TOETVA procedures were performed.
Patient selection was done with predefined criteria: Medically fit (ASA 1), Lobe size less than 6 cm, no previous neck surgery & FNAC negative for malignancy (Bethesda I, II & III).
Each patient was monitored for:
Ease of surgical dissection,
Surgical time,
Intraoperative blood loss,
Postoperative pain,
Occurrence of complications.
Postoperative recovery.
Postoperative Scar & cosmesis.
Results: Total 69 patients were operated by TOETVA Technique from May 2018 till Dec 2020.
Eighteen Total Thyroidectomies & 51 Hemithyroidectomies were performed.
Proper patient selection (ASA 1) helped to complete the procedures without any major complications.
After analysis of the patient’s data, significant advantages were observed with respect to criteria mentioned above.
Conclusions: TOETVA can be considered safe and feasible with several benefits such as ease of surgical dissection, less trauma, faster wound healing in the oral cavity, and earlier recovery with a superior cosmetic outcome.
Amongst all endoscopic approaches for thyroid, TOETVA leaves no cutaneous scar.
Expertise & experience of the operating surgeon in endoscopic surgeries with proper training in TOETVA technique is essential.
Solid organs—thyroid
O054—Thyroidectomy via unilateral axillo-breast approach with gas insufflation: a prospective multicenter European study
David Saavedra-Perez1, M. Manyalich1, P. Dominguez1, J.Vilaça2, J. Jordan3, C. Fondevila1, O. Vidal1
1Hospital Clinic of Barcelona, Unit of Medical and Surgical Endocrinology. Endocrine Surgery. Department of General and Digestive Surgery, Spain. 2Hospital da Luz Arrábida, Endocrine Surgery. Department of General and Digestive Surgery, Portugal. 3Hospital Universitario La Candelaria, Endocrine Surgery. Department of General and Diegstive Surgery, Spain
Background: Surgical approaches for thyroidectomy have undergone a rapid evolution over the past three decades. Unilateral Axillo-Breast Approach (UABA) is one of the best internationally accepted remote access procedures for the treatment of thyroid diseases. The purpose of this prospective cohort study was to evaluate the surgical outcomes of UABA with gas insufflation from three different European Institutions.
Materials and Methods: From July 2015 to December 2019, 170 UABA procedures were performed at three separate European institutions. Restrictive selection criteria were established (i.e.: exclusion criteria included, thyroid nodule diameter > 5 cm, breast diseases, etc.). Follow-up was performed at 2 weeks, 2 months and at 1 year after the surgery. Surgical and esthetical outcomes were analyzed from this prospective cohort study.
Results: There were 27 (15.8%) men and 143 (84.2%) women with a mean age of 46.6 ± 10.2. Mean BMI was 22.57 ± 3.2. No case required conversion from the endoscopic approach to an open procedure. A thyroid lobectomy was performed in all cases, no total thyroidectomy was performed, whereas a completion thyroidectomy was done in 3 (1.8%) cases. Mean operative times were 27.5 ± 5.8 min for subcutaneous dissection, 45.4 ± 7 min for the lobectomy, and 72.9 ± 12.8 min for the total procedure. No hypoparathyroidism was present. There were 10 (5.9%) patients who developed transient recurrent laryngeal nerve (RLN) injury, and 1 (0.6%) persistent. Temporary pectoral and cervical numbness were noted in 95 (55.9%) patients, no permanent numbness was present. Skin injuries and subcutaneous hematoma were present in 5 (2.9%) and 3 (1.8%) patients, all solved at 2 moths from the surgery. No tracheal perforation was present. The final pathology report revealed 82 (48.2%) benign nodules, 67 (39.4%) nodules with underlying papillary thyroid carcinoma, and 21 (12.4%) case follicular carcinoma. Hospital discharge at 1 post-operative day (POD) was achieved in 117 (68.8%) of the patients and, at 2 POD in 53 (31.2%). Esthetical satisfaction was present in 99% of the patients and all patient would be operated on again with the same approach.
Conclusion: Our results suggest that in selected patients and with experienced minimally-invasive endocrine surgical teams, UABA with gas insufflation for thyroidectomy is safe and effective for the treatment of thyroid pathologies, without major complications and with an excellent esthetic profile.
Solid organs—thyroid
O055—Role of ultrasonography in predicting follicular thyroid neoplasm with papillary-like nuclear features
Luigi De Napoli1, Erica Pieroni1, A. Matrone2, G. Boni3, G. Materazzi, 1, C. Gambale2, C.E. Ambrosini1, L. Torregrossa4, A .Aghababyan1
University Hospital, 1Endocrine Surgery, 2Endocrinology, 3General Surgery, 4Pathology, Italy
Background: non-invasive follicular thyroid neoplasm with papillary-like nuclear features (NIFT-P) is considered an encapsulated non-invasive neoplasm. Less is known about the ultrasound features of NIFT-P and particularly of the differences with the follicular variant of papillary thyroid carcinoma (FV-PTC.). The aim of our study is to evaluate the potential differences in US features at diagnosis.
Methods: We reviewed pre-operative digital ultrasound images and reports of 252 thyroid nodules evaluated at the Endocrine Unit of the University Hospital of Pisa, all subsequently treated with surgery at the Endocrine Surgery Unit of the same hospital. Histologic examination revealed NIFT-P (n = 112) and FV-PTC (n = 140). For each nodule we evaluated the following US features: size, composition, echogenicity, shape, margins, and calcifications. Moreover, each nodule was further classified using the 3 main radiological risk-stratification systems: TIRADS, AACE/AME and ATA.
Results: NIFT-P shows like a single nodule in 31.2% of cases and was incidentally discovered after surgery in 18%. Fine needle aspiration cytology was TIR3A in 46.4% of NIFTP group vs. 50.7% of FV-PTC group, TIR3B in 17.9% vs. 26.4%, TIR2 in 14.3% vs. 5% and TIR4 in 1.8% vs. 3.6%. Groups were comparable for size, structure and echogenicity. NIFT-P and FV-PTC were significantly different (p < 0.05) for presence of calcification (5.4% vs. 30%), margins (irregular in 3.6% vs. 16.4%) and shape (taller than wider in 0.9% vs. 7.9%). The combination of regular margins, absence of calcification and wider than tall shape were present in 87.7% of NIFT and in 52.9% of FV-PTC (p < 0.05). Groups were also significantly different in main risk-stratification system. In TIRADS classification NIFT had score 2 in 6.2%, 3 in 58%, 4 in 35.7% of cases while FV-PTC had score 2 in 0.7%, 3 in 35.7%, 4 in 58.6%, 5 in 5%). In ATA and AACE/AME classification NIFT-P resulted highly suspicious in 7.1% vs. 35.7% of FV-PTC.
Conclusion: In spite of similar preoperative cytological reports (TIR3A and TIR3B in nearly 70% of all NIFT-P and FV-PTC) NIFT-P and FV-PTC presented relevant different radiological features. NIFT-P showed ultrasonographic features suggestive for benign nodules. Main radiological risk-stratification system can help to distinguish NIFT-P from FV-PTC.
Solid organs—thyroid
O056—Study of effectiveness intraoperative indocyanine green angiography for the identification of the parathyroid glands during total thyroidectomy
Roman Parfentiev, V.V. Grubnik, V.V. Grubnyk
Odessa National Medical University, Surgical, Ukraine
Postoperative hypocalcemia is a common complication of thyroidectomy. This problem is most often associated with accidental devascularisation or excision of the parathyroid glands (PG).
Aim: was study near-infrared (NIR) fluorescent imaging with intraoperative parathyroid gland indocyanine green (ICG) angiography to help identify and preserve parathyroid glands during total thyroidectomy in order to avoid postoperative hypocalcemia.
Methods: For period from 2017 to 2019 years, 58 patients in Odessa regional hospital were underwent total thyroidectomy. Indications for surgery were multinodular goiter (42), thyroid cancer (11) and Graves’ disease (5). By randomization all patients were divided into two groups: in the first group, 28 patients underwent standard total thyroidectomy, in the second group 30 patients underwent NIR-assisted total thyroidectomy with ICG angiography. Parathyroid autofluorescence was detected using a near infrared/indocyanine green endoscopic system (Karl Storz, Germany). Serum calcium and parathyroid hormone (PTH) levels were compared between the two groups of patients in 1, 7 -15 days after surgery and then 3, 6 months later.
Results: In the first group, on based of a visual assessment of the PG, autotransplantation the PG were conduct in only 4 cases (in 3 cases—one gland, in one case—2 glands). In the second group, autotransplantation was performed in 11 patients (in 8 cases—one gland, in 2 cases—two, in one case—3). The transient postoperative hypocalcemia was observed in 5 patients of the first group (17,86%) and in the 2 patients of second group (6,67%) on 5–10 postoperative days. In the first group 1 patient at 3 months after surgery had permanent hypocalcemia.
Conclusion: This technique is safe and provides improved detecting and assessment of the perfusion of the PG. The need for autotransplantation of the PG can be determined more objectively using ICG imaging than simple visualization.
Solid organs—thyroid
O057—Impact of energy-based device in pediatric thyroid surgery
Luigi De Napoli, Benard Gjeloshi, B. Gjeloshi, C. Becucci, E. Pieroni, C.A. Ambrosini, G. Materazzi, C. Spinelli, F. Vagelli, G. Taddei, A. Matrone, A. Aghababyan
University Hospital, Endocrine Surgery, Italy
Aim: Postoperative hypocalcemia (PH) is a common complication following thyroid surgery especially in pediatric patients. The aim of this study is to compare PH between pediatric patients treated with conventional clamp-and-tie technique or energy-based device.
Methods: Four hundred-fifteen consecutive pediatric patients (< 19 yrs old) underwent total thyroidectomy with or without lymph node dissection between 2007 and 2020 in Endocrine Surgery Unit of Pisa. Surgery was performed for several thyroid diseases [multinodular goiter, indeterminate nodules (TIR 3), Grave’s disease, differentiated and medullary thyroid cancer]. Patients were divided in two groups: energy-based device group (Group A—177 pts) and clamp-and-tie technique (Group B—238 pts).
PH was defined as postoperative calcium levels < 8.0 mg/dL with need of treatment with calcium supplementation and activated Vitamin D metabolites.
Results: no significant differences were shown between two groups in sex, age, thyroid volume, nodules dimension, extent of surgery and histology. PH was lower in group A compared with group B in patients affected by multinodular goiter (11.9% vs 17.6%), indeterminate nodules (14.3% vs 22.9%), Graves disease (11.8% vs 18%) and thyroid cancer (11.9% vs 16.5%), although this difference was not significant. If we consider extent of surgery PH in total thyroidectomy was 12.9% in group A and 16.5% in group B (p = 0.38) while in total thyroidectomy plus central neck dissection (CND) PH was 9.3%(4/43) in group A and 23.6%(13/55) in group B (p < 0.05). Operative time was similar between two groups for each procedure. Postoperative hospital stay was 1.86 ± 0.95 days in groups A (16.3% with more than 2 days of hospitalization) and 2.02 ± 1.1 days in group B (20.5% with more than 2 days of hospitalization) (p = 0.33). Postoperative surgical bleeding occurred in 3/238 (1.7%) patients of group B while no case was reported in group A.
Conclusions: Use of energy-based device in pediatric population can significantly reduce PH in patients submitted to total thyroidectomy and especially in those experienced CND. Moreover a safer hemostasis is guaranteed with reduction of postoperative surgical bleeding.
Solid organs—thyroid
O206—Ultrasound guided radiofrequency ablation of benign thyroid nodules—key words—radiofrequency, thyroid, ultrasound
Neha Shah
Cumballa Hill hospital, Otolaryngology surgical/Radiofrequency/ OSA, India
Recent advances with the use of technology in various surgical procedures entails the use of Radiofrequency ablation and guidance under ultrasound control.
The principle and technique is applied to benign thyroid nodules as well as papillary carcinomas of thyroid.
It is a new novel minimally invasive technique to save the thyroid gland amidst safe outcomes.
Upper GI—benign esophageal disorders
O077—Significance of complying with Standard protocol for endoscopic diagnosis of barrett’s oesophagus in district general hospital
Ahmed Elnabil-Mortada
St Luke's Hospital/ Ain Shams University, General Surgery, Egypt
Background: Detection of early dysplastic changes associated with Barrett’s oesophagus (BO) is the pillar for successful therapeutics endoscopic treatment. While the technical competence of Oesophago-gastro-duodenoscopy (OGD) is rapidly acquired, the quality of the diagnostic accuracy is still highly variable especially in non-specialized endoscopic units. We planned to audit our endoscopic data for Barrett’s to measure the adherence to the current guidelines regarding the endoscopic description and reporting, aiming to improve the quality of our practice in district general hospital as we noted a great variability between the endoscopists.
Methods: We conducted a retrospective audit study, reviewing OGD reports on EndoRAAD reporting system in our hospital. We Collected the following data from Barrett’s reports: age, sex, endoscopist, indication, photo documentation, description using Prague Criteria, Paris classification, and biopsy protocol. Aggregate data was reported in frequencies and percentages. We measured our practice against the standards of the British Society of Gastroenterology (BSG) and Association of Upper Gastrointestinal Surgeons of Great Britain and Ireland (AUGIS).
Results: Total of 3556 OGD reports have been reviewed, with 256 mentioned Barrett's (7.1%). Mean age was 62.7 ± 13.5 year – old, with male percentage to female was 68% to 32% respectively. Prague’s criteria were used in only 35% of the report, none of them used Paris classification for the detected lesions, Seattle biopsy protocol wasn’t used in 45.4% with significant higher negative pathology (51.5%) compared with (23.6%) in reports with four quadrant biopsies (54.6%). The best description was done by advanced nurse practitioner (ANP), followed by Gastroenterology, then the Surgeons.
Conclusions: In the absence of standard protocol for endoscopic diagnosis of BO, the adherence for the guidelines was suboptimal, and poor, thereby adversely affecting the true incidence of adenocarcinoma in BO patients. We implemented new protocol in our DGH, to ensure quality improvement of our practice.
Keywords: Barrett’s Oesophagus. Endoscopic Surveillance. Prague Criteria. Seattle Protocol.
Upper GI—benign esophageal disorders
O197—Paraesophageal hernia repair in the elderly: outcomes from a 10 year retrospective study
Michael D'Elia, Amer Jarrar, A Negar, A Neville, J. Mamazza
The Ottawa Hospital, Department of Surgery, Canada
Aims: Laparoscopic surgery has become a preferred for management of paraesophageal hernias (PEH), however, management, surgery versus watchful waiting, remains controversial in older patients.
Methods: This retrospective study analyzed the outcomes of PEH repair in elderly patients surgically managed at The Ottawa Hospital over a 10-year period. Patients more than 60 years old, who underwent PEH repair, were examined with respect to presentation, technique and associated complications.
Results: Despite similar demographics, our study groups showed significantly different characteristics of surgical techniques. Most surgeries were performed laparoscopically; however, patients ≥ 70 years underwent statistically more open and emergency surgeries compared to the younger group. Despite a 30-day postoperative complication rate of 45% and 13% in the ≥ 70yo and 60-69yo group respectively, the rates during elective repair were similar. More remarkably, there were no mortalities within the younger age group, while the 30-day mortality rate was 5% in patients aged ≥ 70 years, including a twofold increase with emergency repair (4 vs 2 patients).CONCLUSION: The management of PEHs in the older age group remains a controversial area in relation a surgical versus watchful waiting approach. Here we show that in the PEH patients ≥ 70 years who undergo surgical management experience more open and emergency procedures, which are associated with higher complication rates. However, examining the elective setting these complications balance out and are similar between each cohort. Therefore, the greatest benefit for patient outcome is associated with laparoscopic elective repair, putting into question the value of watchful waiting in older PEH patients.
Upper GI—benign esophageal disorders
O218—Use of polypropylene strips for reinforcement of the cruroplasty in laparoscopic paraesophageal hernia repair: a retrospective cohort study
Matthijs Van den Dop1, G. De Smet1, A. Mamound2, J. Lange1, B. Wijnhoven1, W. Hueting2
1Erasmus University Medical Centre, Surgery, 2Alrijne Hospital, Surgery, The Netherlands
Introduction: Laparoscopic paraesophageal hernia repair is an effective treatment for symptomatic paraesophageal hernias. To reduce recurrence rates, the use of prosthetics for the crural repair has been suggested. Mesh-related complications are rare, but known to be disastrous. To address another form of crural repair, polypropylene strips are suggested. This study aimed to assess peri- and postoperative complications of reinforcement of the cruroplasty with polypropylene strips.
Methods: From 2013 to 2020, patients with a type II, III or IV primary or recurrent paraesophageal hernia that underwent cruroplasty with polypropylene strips were retrospectively reviewed. Intra- and postoperative complications were graded according to the Clavien-Dindo classification. The incidence of symptomatic recurrent hiatal hernia (CT or endoscopy proven) and hospital stay were assessed.
Results: One-hundred-and-fifty-eight patients were included. Mean age was 65 years (standard deviation 10.4), 119 patients were female (75.3%). Almost 50% of surgeries took place between 2018 and 2020. Median follow-up was 7 months (interquartile range 17.5). Mean operation time in the primary hernia group was 159 min (standard deviation 39.0), and length of stay was 4.4 days. In 3/158 patients (2.0%) intra-operative complications occurred. Two patients developed a grade IV and seven patients a grade III postoperative complication. No mortality was recorded. Twelve recurrences (8.2%) were detected in the primary hernia group, and one (9.1%) in the recurrent hernia group.
Conclusion: There were no mesh-related complications seen and symptomatic recurrence rate was low, but longer follow up is needed.


Upper GI—benign esophageal disorders
O219—Promising results in the treatment of a tracheoesophageal fistula with autologous Obsidian® Regenerative Fistula Treatment BioMatrix?
Antonia Gantschnigg, O.O. Koch, J. Holzinger, K. Emmanuel
University Hospital Salzburg, Department of general, visceral and thoracic surgery, Austria
Aim: Acquired benign tracheoesophageal fistula is a rarely seen condition, mainly developed postoperative after esophageal resection or due to tracheal injury after intubation. Complications include aspiration and pneumonia. Treatment so far consists in esophageal stent implantation or surgical treatment. Autologous Obsidian® RFT (Regenerative Fistula Treatment) BioMatrix, uses thrombocytes out of patients’ blood, embedded in a fibrinogen matrix. First studies have shown an improved healing in gastrointestinal anastomoses. We present the worldwide first use of an autologous BioMatrix in a postoperative tracheoesophageal fistula.
Methods: We present the case of a 47 years old patient with a tracheoesophageal fistula following abdomino-right-thoracic esophagectomy with intrathoracic anastomosis for an adenocarcinoma of the gastroesophageal junction (G2 T3 N0 cM0 R0). The patient received perioperative chemotherapy. Postoperatively he developed an intense and persistence cough. Endoscopy confirmed a tracheoesophageal fistula 14 days following surgery with a diameter of 4 mm. An esophageal stent was implanted, the patient recovered and received adjuvant chemotherapy. Meanwhile, the fistula enlarged to a diameter of 12 × 8 mm, with no signs of inflammation or wound healing tendency. Therefore, chemotherapy was stopped. To avoid surgical reconstruction with possible complications, an experimental use of Obsidian BioMatrix was initiated.
Results: 1.6 ml of the BioMatrix was applied in the fistula during bronchoscopy. The fistula was completely closed post interventional as well as 2 weeks after in the control investigation. Nevertheless, four weeks later the patient developed a cough again. Bronchoscopy confirmed the fistula with a diameter of 4 mm. Once more, 1.7 ml of the biomatrix was applied, the fistula was closed again, the patient asymptomatic and released.
Conclusion: The current role of tissue sealants as anastomotic adjuncts remains unclear. Thrombocytes play the key role in wound healing and an active role in immune defense. We aimed to assess the impact of a novel autologous thrombocyte rich agent (autologous Obsidian® RFT BioMatrix; GergMed Medizintechnik, Bayern, Germany) on a tracheoesophageal fistula. This case report shows that Obsidian® RFT could be a solution in recurrent fistulas following bowel anastomosis. Nevertheless, further studies are necessary to prove our hypothesis, that Obsidian® RFT is suitable in such conditions.
Upper GI—benign esophageal disorders
O220—Quality of Life and symptom assessment in para-esophageal hernias; a systematic literature review of reporting standards
Nikhil Patel1, Aiysha Puri1, A. Puri1, V. Sounderajah1, L. Ferri2, E. Griffiths3, D. Low3, N. Maynard3, C. Mueller2, M. Pera6, M .van Berge Henegouwen7, D. Watson8, G. Zaninotto1, G. Hanna1, S. Markar1
1Imperial College London, Department of Surgery and Cancer, United Kingdom. 2McGill University Health Centre, Montreal, Division of Thoracic and Upper Gastrointestinal Surgery, Canada. 3Queen Elizabeth Hospital, Birmingham, Department of Upper Gastrointestinal Surgery, United Kingdom. 4Virginia Mason Medical Center, Seattle, Department of Thoracic Surgery and Thoracic Oncology, USA. 5Churchill Hospital, Oxford, Oxford Oesophagogastric Centre, United Kingdom. 6University Hospital del Mar, Barcelona, Department of Surgery, Spain. 7University Medical Center Amsterdam, Department of Surgery, The Netherlands. 8Flinders Medical Centre, Adelaide, Discipline of Surgery, Australia
Aims: Para-esophageal hernias (PEH) present with a range of symptoms affecting physical and mental health. This systematic review aims to assess the quality of reporting standards for patients with PEH, identify the most frequently used quality of life (QOL) and symptom severity assessment tools in PEH and to ascertain additional symptoms reported by these patients not captured by these tools.
Methods: A systematic literature review according to PRISMA protocols was carried out following a literature search of MEDLINE, Embase and Cochrane databases for studies published between January 1960 and May 2020. Published abstracts from conference proceedings were included. Data on QOL tools used and reported symptoms were extracted.
Results: This review included 220 studies reporting on 28 353 patients. A total of 46 different QOL and symptom severity tools were used across all studies, and 89 different symptoms were reported. The most frequently utilized QOL tool was the GERD-HRQL symptom severity instrument (47.7%), 57.2% of studies utilized more than 2 QOL tools and ‘dysphagia’ was the most frequently reported symptom, in 55.0% of studies. Notably, respiratory and cardiovascular symptoms, although less common than GI symptoms, were reported and included ‘dyspnea’ reported in 35 studies (15.9%).
Conclusion: There lacks a QOL assessment tool that captures the range of symptoms associated with PEH. Reporting standards for this cohort must be improved to compare patient outcomes before and after surgery. Further investigations must seek to develop a PEH specific tool, that encompasses the relative importance of symptoms when considering surgical intervention and assessing symptomatic improvement following surgery.
Upper GI—benign esophageal disorders
O222—The treatment of Zenker diverticulum with flexible endoscopy: preliminary experience from a single center
Laura Fortuna1, A. Bottari1, C. Agostini1, D. Bisogni2, R. Manetti2, F. Coratti1, F. Cianchi1, F. Staderini1
AOU CAREGGI, 1Chirurgia dell'apparato digerente, 2HepatoPancreaticoBiliary, Italy
Aims: Zenker diverticulum (ZD) is a false diverticulum arising through the Killian triangle. This benign condition is a common cause of cervical dysphagia, affecting patients’ quality of life. Other frequent symptoms are halitosis, regurgitations, cough and aspiration pneumonia. Treatment is necessary in case of persistent symptoms. Surgical options include: left transcervical diverticulectomy, rigid endoscopic stapling and flexible endoscopic myotomy. Rigid diverticulectomy can't be considered a minimally invasive technique and it is burdened with a quite relevant morbidity and mortality rate. Moreover the insertion of the rigid diverticuloscopy is challenging, especially in case of small diverticula. Flexible endoscopy, firstly introduced by Mulder and colleagues in 1982, offers several advantages in terms of operative time, healthcare costs, hospital days, realimentation and recurrence. Furthermore, the possibility to achieve a better visualization of the septum of the diverticulum allows an optimal cricopharyngeal myotomy. The aim of the study was to retrospectively evaluate our first experience of flexible endoscopic septum division (FESD).
Methods: FESD was performed with the patient in the left lateral position under general anesthesia. The cricopharyngeal myotomy was conducted with Flush-knife BT (Fujifilm Co., Tokyo, Japan) through a single-incision technique, until the diverticulum was opened into the esophageal lumen. At the end of the procedure the mucosal defect was closed with endoclips.
Results: We treated 8 cases of ZD with FESD, 5 men and 3 women. No intraoperative adverse events we reported. Mean operative time was 81 min. A complete resolution of the symptoms was achieved in 100% of patients. No cases of perforation, aspiration pneumonia, recurrence was observed and mortality was 0%. Mean hospital stay was 3 days, including the day of the procedure.
Conclusions: Along with the available literature data, our single-center experience seems to confirm that flexible endoscopy is a safe and effective technique for the treatment of ZD or whenever rigid endoscopy is not feasible with excellent patient outcomes.
Upper GI—benign esophageal disorders
O223—Laparoscopic transhiatal approach for the benign duplex tumors of the distal oesophagus
Attila Paszt1, L. Andrási1, A. Ottlakán1, Z.S. Simonka1, Z. Szepes2, G.Y. Lázár1
University of Szeged, 1Department of Surgery, 2Department of Internal Medicine, Hungary
B Benign oesophageal tumors are rare conditions and account for about 20% of oesophageal neoplasms on autopsy. The duplex benign oesophageal tumors are extremly rare. During the past decade the laparoscopic transhiatal approach, indicated for benign oesophageal diseases has became well accepted among specialized surgeons with a low rate of morbidity and mortality. Experience in surgical resection and enucleation of benign tumor of the oesophagus are limited.
The aim of this study was to report on the intra- and postoperative complications of laparoscopic transhiatal enucleation and partial resection of duplex esophageal benign tumors in the Department of Surgery of University of Szeged.
Methods: We analyzed retrospectively main outcome measures included operative approaches, tumor's locations and sizes, pathology and surgical outcomes between August 2017 and October 2019. Standard diagnostical protocol (endoscopy, biopsy, chest and abdominal CT/MRI, endosonography) was performed in all cases. The duplex tumors locations were in the distal oesophagus near to the cardia. Intra-operative endoscopy was used in all the procedures to control mucosal integrity.
Results: The mean operative time was 133 min. There were no conversion. The intraoperative air leak tests were negative. The average blood loss was 80 ml. No intra and postoperative complication occurred, mortality was nil. All patients had an uneventful recovery. Mean hospital stay was 13 days. Histopathology showed a twin leiomyoma in the first patient and a double gastrointestinal stromal tumor in the second patient. Tumor size ranged from 2.7 to 3.8 cm. There has been no tumor recurrence at a mean follow-up of 21 months. Both of the patients have adequate swallowing function and good quality of life.
Conclusions: Laparoscopic transhiatal partial resection and enucleation of the duplex oesophageal tumors are a safe and feasible alternatives for experienced professionals. This access can improve the surgical outcomes when compared with the thoracoscopy or open methods. The optimal approaches should be tailored based on the location and size of the duplex tumors.
Upper GI—esophageal cancer
O001—There is no correlation between a delayed emptying of the gastric conduit and the occurrence of an anastomotic leakage after Ivor-Lewis esophagectomy
Benjamin Babic1, L. Schiffmann1, C. Mallmann1, P. Schiller2, S.H. Chon1, H. Fuchs1, W. Schröder1, C. Bruns1
1University Hospital Cologne, Department of General, Visceral, Cancer and Transplant Surgery, 2University of Cologne Institute of Medical Statistics and Computational Biology, Germany
Introduction: Thoracoabdominal esophagectomy with gastric pull-up is the gold standard in the surgical therapy of esophageal cancer. Delayed gastric emptying of the gastric conduit (DGCE) is the most common functional disorder after Ivor-Lewis esophagectomy. Pneumonia is significantly more often in patients with a DGCE. It remains unclear, if there is a correlation between DGCE and the occurrence of an anastomotic leakage. Aim of our retrospective analysis of more than 800 patients is to analyze, if an anastomotic leakage is more likely to happen in patients with a DGCE.
Methods: A total number of 816 patients were included in this study. All of the patients have had an Ivor-Lewis esophagectomy due to esophageal or esophagogastric junction cancer between 2013 and 2018 in our center. Esophagogastric end to side anastomosis has been performed with a circular stapling device in all patients. The collective has been divided in two groups, depending on the occurrence of an anastomotic leakage Type II (AL). AL occurred in 47 Patients (Group I) and was treated successfully in all patients by endoluminal therapy (ECCG grade II). Group I was compared to 769 patients (Group II) without AL regarding the occurrence of DGCE. In addition, pretherapeutic risk factors were compared among the two groups. DGCE was diagnosed if patients suffered from regurgitation on the 5th postoperative day and an dilatation of the gastric conduit was visible in a chest x-ray.
Results: 27.7% of all patients suffered from DGCE postoperatively. Female patients had an significantly higher chance to suffer from DGCE than male patients (34.4%vs. 26.2% vs., p = 0.040). Pneumonia was more common in patients with DGCE do suffer from pneumonia (13.7% vs. 8.5%, p = 0.025), furthermore hospitalization was longer in these patients (median 17d vs. 14d, p < 0.001). There was no difference in the rate of anastomotic leakage, it was 5.8% in patients with and without a DGCE and thus equal in both groups. The subgroup analysis showed that ASA > 3 a (7.6% vs. 4.4%, p = 0.05) and a squamous cell carcinoma (9.8% vs. 4.7%, p = 0.01) were independent risk factors for the occurrence of an anastomotic leakage.
Conclusion: Our study confirms that DGCE after Ivor-Lewis esophagectomy is a common finding in a standardized collective of patients in a high volume center. This functional disorder is associated with a higher rate of pneumonia. Still, there is no correlation between DGCE and the occurrence of a anastomotic leakage after esophagectomy. The hypothesis, that an DGCE leads to a higher pressure on the anastomosis and leads to an AL in consequence, can be refuted. DGCE is no pathogenetic factor for an AL.
Upper GI—esophageal cancer
O002—Short and long-term outcomes of the first minimally invasive esophagectomy program in Israel: shifting the paradigm in a high-volume center
Daniel Solomon1, E. Sarfaty1, N. Menasherov1, V. Bard, R. Bueno2, H. Kashtan1
1Rabin Medical Center, Department of General Surgery, Israel, 2Brigham and Women's Hospital, Department of Thoracic Surgery, USA
Background: Esophagectomy is associated with significant perioperative morbidity. Significant improvements in short-term outcomes have been achieved with the adoption of minimally invasive techniques. We sought to describe the implementation of the first minimally invasive esophagectomy (MIE) program at a high-volume, tertiary academic medical center in Israel, under the direct mentorship of some of the early adopters and developers of these techniques.
Methods: All Patients who underwent MIE between January 2011 and February 2018 for esophageal adenocarcinoma were included from a prospectively-maintained database. The MIE patients underwent either a 3-field esophagectomy (3F-MIE) or a 2-field transthoracic esophagectomy (2F-MIE) and were grouped into an early and late cohort for each surgical approach.
Results: Overall, 177 patients underwent MIE. Three-field MIE was performed in 155 (87.6%) patients. Two-field MIE was performed in 22 (12.4%) patients. Following the introduction of the program in 2012, the number of MIE performed increased during the first 3 years (n = 44/47, 93.6% in 2014), with 2F-MIE being increasingly performed during the last four years (from n = 2/47, 4.2% in 2014 to n = 11/34, 32.4% in 2017–2018) (Fig. 1). Neoadjuvant treatment was administered to 135 (76.3%) patients. Intraoperatively, 6 (3.4%) patients required conversion to open procedure. Postoperatively, median length of stay was 10 days (IQR 8–18), with 37 (20.9%) patients requiring unplanned intensive care admission. Major complications were reported in 72 (40.7%) patients, leak in 32 (17.6%) patients. Among 3F-MIE patients, operative time was lower in the late cohort (median, IQR1-3 255, 228–292 vs 280, 248–315 min, p = 0.015) and lymph node yield was higher than among those from the early cohort (median, IQR1-3 n = 15, 11–21 vs n = 11, 8–15, p = 0.001) (Table 1). Similarly, the late 2F-MIE cohort had a significantly higher number of retrieved lymph nodes than the early cohort (median, IQR1-3 n = 23.5, 12.5–29.2 vs n = 13.5, 8.75–18.7, p = 0.048).
Conclusions: We describe the evolution and implementation of an MIE program with acceptable perioperative and oncologic outcomes in a major academic medical center. Strong mentorship and continuous support are of foremost importance for the successful adoption of these techniques (Table 1).
Table 1.
Learning curve variables, early vs late cohort, 3F-MIE (n = 155)
| Variables | Early Cohort n = 77 |
Late Cohort n = 78 |
p Value |
|---|---|---|---|
| Operative time (minutes), median (IQR) | 280 (248–315) | 255 (228–292) | 0.015 |
| Conversion | 3 (3.9) | 2 (2.6) | 0.681 |
| Length of stay (days), median (IQR) | 10 (8–16) | 9 (8–19) | 0.892 |
| Lymph node yield | 11 (8–15) | 15 (11–21) | 0.001 |
| Unplanned ICU admission | 15 (19.5) | 13 (16.7) | 0.681 |
| Overall, any 30-day complications | 40 (54.1) | 43 (57.3) | 0.743 |
| Pulmonary complications | 19 (24.7) | 15 (19.2) | 0.443 |
| Leak | 14 (18.9) | 13 (17.1) | 0.833 |
| Severe complications (Clavien-Dindo > 2) | 26 (35.6) | 30 (38.5) | 0.739 |
| 30-day mortality | 5 (6.5) | 1 (1.3) | 0.117 |
All data are n (%) unless otherwise specified. P values < 0.05 are considered significant
IQR interquartile range, ICU intensive care unit
Figure 1 Trends in MIE, 2011–2018 (as percentages of total esophagectomies performed)

Upper GI—esophageal cancer
O003—3D printing in esophageal surgery. A new tool in minimally invasive esophagectomy
Miguel Angel Steiner1, D. Trapero2, J.M. Monturiol1
1Hospital General Universitario Gregorio Marañón, General and Digestive Surgery Spain, 2Hospital General Universitario Gregorio Marañón 3D Printing Laboratory, Spain
Aims: Minimally invasive surgery in esophageal cancer currently includes the laparo-thoracoscopic approach, with the preparation and elevation of the conduit and performance of the intrathoracic anastomosis when two-field esophagectomy or Ivor Lewis is indicated. In this scenario, in our center a circular mechanical anastomosis is performed between the esophagus and the conduit. With a volume of more than 14 cases per year and after a study of the technical details and their possible improvements, a modification of the procedure was carried out, with the use of a tool designed and printed in 3D in the operating room.
Methods: With the collaboration of the 3D printing laboratory of our center, a conical device was designed to be placed at the end of the circular stapler head, serving as an introducer through the costal wall. After several prototypes, this device was 3D printed with a resin additive printer using a biocompatible material. In this way, the introduction of the stapler through the intercostal spaces would be facilitated, thus avoiding excessive enlargement of the insertion incision or the risks of pulling out the conduit for the extrathoracic assembly of the anastomosis.
Results: This modification in the technique, with the incorporation of a conical 3D printed device added to the head of the circular stapler, facilitates its introduction through the rigid and not very compliant costal wall. By widening the entry hole no more than 2.5 cm, a mini thoracotomy or the need to separate the rib arches with self-separators is avoided. With the stapler already inside the thorax, in a second stage the intrathoracic esophagus-gastric anastomosis is performed without the risks of injury, shearing, rotation or traction of the conduit, present during traction outside the rib cage.
Conclusion: 3D design and printing applied to medicine has only a few years of experience and its application in surgical specialties is progressing by leaps and bounds. This technology makes available to doctors and surgeons the possibility of innovating and designing an endless number of instruments and tools that can improve processes and solve problems in daily clinical practice.
Upper GI—esophageal cancer
O005—Development of the severity of esophageal anastomic leak (SEAL) score: a tool to predict mortality at diagnosis in patients with anastomotic leakage after esophagectomy
Sander Ubels1, M. Verstegen1, S. Bouwense2, G. Hannink3, P. Siersema4, B. Klarenbeek1, F. van Workum5, C. Rosman1 on behalf of the TENTACLE – Esophagus collaborative group
1Radboudumc, Surgery The Netherlands, 2Maastricht UMC + Surgery The Netherlands, 3Radboudumc Operating Rooms The Netherlands, 4Radboudumc Gastroenterology and Hepatology The Netherlands, 5Canisius-Wilhelmina Ziekenhuis Surgery The Netherlands
Aims: Anastomotic leakage (AL) is a common and severe complication after esophagectomy, but it is largely unknown how to assess leakage severity at the time of diagnosis. We aimed to develop the Severity of Esophageal Anastomotic Leak (SEAL) score, a tool to predict leakage severity at the time of diagnosis.
Methods: The TENTACLE – Esophagus study is an international retrospective cohort study, in which 1509 patients with AL after esophagectomy between 2011 and 2019 were included in 71 centers from 20 countries. Potential predictors of mortality were patient parameters at diagnosis (e.g. diet at diagnosis, organ failure) and leakage parameters (e.g. fluid collections, gastric tube condition, leakage circumference). Primary outcome was 90-day mortality. Logistic regression was used to develop the SEAL score, comprising four grades of leakage severity (i.e. mild, moderate, severe and critical). Severity grade cut-offs were predefined and based on the individually predicted risk of 90-day mortality: 0–5%, 5–15%, 15–25% and 25–100%, respectively. Internal validation was performed by bootstrapping. The study protocol is accessible at www.tentaclestudy.com.
Results: The 90-day mortality rate in the included 1509 patients was 11.7%. The model had good discrimination (c-index 0.77; 95%CI 0.73 – 0.81) and calibration (calibration intercept 0.00; 95%CI -0.17 – 0.17; calibration slope 1.14; 95%CI 0.95 – 1.32) after internal validation. The model classified 25.8% leakage patients as mild, 50.9% as moderate, 12.9% as severe and 10.5% as critical. The in-hospital, 30-day, 90-day and 180-day mortality rates, length of (ICU) stay and time to leak healing worsened statistically significantly with higher classes of AL severity.
Conclusion: Anastomotic leakage is a severe complication with a 90-day mortality rate of 11.6%. The SEAL score is a tool which combines 12 patient and leak parameters at time of leak diagnosis and comprises four classes of leakage severity based on individual predictions of mortality. The SEAL score is instrumental in understanding AL severity in clinical practice and may be used to correct for leakage severity when assessing the efficacy of different treatments of AL after esophagectomy.
Upper GI—esophageal cancer
O006—Patient perspective on quality of oesophagogastric cancer surgery
James Butterworth, A. Tsai, P.R. Boshier, S. Mavroveli, G.B. Hanna
Imperial College London, Cancer and Surgery, United Kingdom
Introduction: “Nothing about us without us” is a phrase adopted by patient communities seeking broader patient participation within healthcare system planning. There is an increased focus on patient involvement in care and decision making from the strategic government perspective within the NHS England 5-year forward view. Although expert opinion regarding quality of oesophagogastric surgery has been previously reported, patients’ opinion regarding quality of surgery has not yet been explored.
Method: Two in-depth focus groups were conducted with 10 participants from the oesophageal patient association (OPA), male:female ratio 7:3. median age 71.5 (range 60–87), facilitated by the main investigator (JB). Participants’ median time since oesophagogastric resection was 4.9 years (range 1.5–23.3) and 50% (n = 5) had received either adjuvant or neo-adjuvant chemoradiotherapy. Group discussions were recorded, transcribed verbatim and analysed for emergent themes. These themes were utilised to construct the semi-structured survey subsequently completed by 41 OPA participants (median age was 69 years (51 – 86 years) and male:female ratio 23:18). Participants were encouraged to share their opinion regarding quality of surgery in trials, their concerns/perception of challenges regarding quality of surgery and the quality of surgery in trials and potential mitigating strategies.
Results: 45 emergent themes emerged from the focus group thematic analysis falling within 3 over-arching categories: patients’ perspective on quality of surgery (n = 16); patient’s concerns/perception of challenges regarding quality of surgery in Upper GI trials (n = 16), and; patient’s proposed mitigating strategies to overcome challenges to quality of surgery (n = 13). From the patient survey the majority of participants (95.2%) agreed that their ‘trust’ and/or ‘confidence in their surgeon’ influenced their perception of quality of surgery, explaining it is ‘vital before surgery’. Key identified challenges included: lack of funding (73.2%), and; insufficient beds for the operations to be performed (e.g. Intensive Care bed spaces) (87.8%). Seminal strategies to overcome identified challenges to quality of surgery included: further education/training for non-specialist care providers and centres in gastro-oesophageal cancer (94.1%); structured monitoring of surgery assessing Upper GI surgeons’ skill/competencies (73.1%).
Conclusion: In the first survey of patient perception of quality of oesophagogastric cancer surgery a high level of participant support was evident regarding patient perceived challenges to quality of surgery and proposed mitigating strategies. Public healthcare planners and members of the surgical oncology community should heed attention regarding the importance of patients’ reported challenges and their proposed strategies to improve quality of surgery, including implementation of an educational programmes for non-specialist centres and a monitoring mechanism to ensure expert agreed operative standards are being achieved.
Upper GI—esophageal cancer
O041—Impact of imaging magnification on upper GI surgery: single-center analysis
Francesco Puccetti, L. Ottaviani, S.Battaglia, P. Parise, A. Cossu, L. Barbieri, U. Elmore, U. Casiraghi, R. Rosati
IRCCS San Raffaele Hospital, Gastrointestinal Surgery, Italy
Aims: The minimally invasive technique has been increasingly applied in upper gastrointestinal surgery. Imaging magnification is a relevant component of keyhole surgery and video systems have been improving over time. This study aims to compare technical and surgical outcomes following the use of 4 K and traditional high-resolution (HR) imaging systems.
Methods: This study retrospectively analyzed a single-center series of patients undergoing upper GI surgery for cancer between May 2014 and December 2020. Both gastric and esophageal surgery has been performed by three surgeons through a minimally invasive approach. 4 K imaging system (Olympus VISERA® and SONY Pro® monitor) has been institutionally introduced in April 2018, replacing the traditional HR monitors. Primary outcomes were operative time, blood loss, LN harvest, and ratio. Length of hospital stay (LOS) as well as surgeons' evaluation was collected as secondary outcomes.
Results: This study included 401 patients presenting with upper GI cancer. The median age was 67 (58–73), and 70.8% was male. The study population underwent either minimally invasive Ivor Lewis esophagectomy (248), total (97), or distal gastrectomy (56), while 4 K resolution was applied in 155, 53, and 31 patients, respectively. 4 K imaging system significantly improved both mean operative time and median lymph node harvest after esophagectomy (p-value > 0.001). Although median operative blood loss did not change between groups, distal gastrectomy appeared to require more intraoperative blood transfusions when performed with traditional HR (p-value 0.004). Intraoperative complication rate and LOS were similar between groups. Surgeons' evaluations supported the use of 4 K resolution imaging for all procedures (100%).
Conclusions: Although the 4 K resolution imaging increased surgeons' confidence for upper GI cancer resections, it also provided measurable improvements after esophagectomy, such as a significantly shorter operative time and higher lymph node harvest.
| TG (97 pts) | p-value | DG (56 pts) | p-value | IL (248 pts) | p-value | ||||||||||
|---|---|---|---|---|---|---|---|---|---|---|---|---|---|---|---|
| HR (44 pts) | 4 K (53 pts) | HR (25 pts) | 4 K (31 pts) | HR (93 pts) | 4 K (155 pts) | ||||||||||
| Mean operative time (± SD), min | 209 | (± 47) | 209 | (± 52) | 0,913 | 219 | (± 56) | 217 | (± 50) | 0,698 | 280 | (± 47) | 255 | (± 40) | > 0,001 |
| Median blood loss (IQR), cc | 200 | (100–275) | 150 | (63–300) | 0,438 | 200 | (100–288) | 150 | (0–200) | 0,297 | 200 | (100–250) | 200 | (100–250) | 0,704 |
| Intraoperative transfusions | 1 | (2,3%) | 6 | (11,3%) | 0,069 | 4 | (16%) | 0 | (0%) | 0,004 | 1 | (1,1%) | 2 | (1,3%) | 0,880 |
| Intraoperative complications1 | 3 | (6,8%) | 8 | (15,1%) | 0,191 | 0 | (0%) | 2 | (6,5%) | 0,119 | 4 | (4,3%) | 8 | (5,2%) | 0,785 |
| Median LN harvest (IQR) | 37 | (27–47) | 34,5 | (26–49) | 0,877 | 32 | (22–43) | 30 | (22–42) | 0,912 | 41 | (31–51) | 54 | (41–71) | > 0,001 |
| Mean LN ratio (± SD) | 0,10 | (± 0,20) | 0,09 | (± 0,20) | 0,322 | 0,07 | (± 0,13) | 0,10 | (± 0,20) | 0,809 | 0,04 | (± 0,09) | 0,05 | (± 0,10) | 0,711 |
| Median LOS (IQR), days | 8 | (6–11) | 7 | (7–9) | 0,499 | 8 | (6–9) | 8 | (6–17) | 0,243 | 14 | (11–26) | 13 | (10–26) | 0,460 |
Upper GI—esophageal cancer
O042—TreatmENT of anastomotiC leakage after esophagectomy (TENTACLE—Esophagus) study: efficacy of different initial treatment strategies for anastomotic leakage
Sander Ubels1, M. Verstegen1, S. Bouwense2, G. Hannink3, P. Siersema4, B. Klarenbeek1, F. van Workum5, C. Rosman1 on behalf of the TENTACLE – Esophagus collaborative group
1Radboudumc, Surgery, 2Maastricht UMC + , Surgery, 3Radboudumc, Operating Rooms, 4Radboudumc, Gastroenterology and Hepatology, 5Canisius-Wilhelmina Ziekenhuis, Surgery, The Netherlands
Aims: Anastomotic leakage (AL) is a common and severe complication after esophagectomy. It is largely unknown which primary treatments are most effective for which type of leak. We aimed to investigate the effectiveness of different primary treatments of AL after esophagectomy.
Methods: The TENTACLE – Esophagus study is an international retrospective cohort study, in which 1509 patients with AL after esophagectomy between 2011 and 2019 were included. Detailed data were collected regarding case mix, resection (e.g. minimally invasive resection), leakage characteristics (e.g. organ failure, leak circumference, intrathoracic contamination) and leakage treatment (e.g. hours from diagnosis to treatment, primary and secondary treatment modalities such as endoscopic, radiologic and surgical treatment). An elaborate data quality validation and data accuracy assessment were performed. Primary outcome was 90-day mortality and secondary outcomes included length of stay and leak healing time. Regression analysis will be used to analyze the effectiveness of primary treatments after correction for patient-, surgery-, and leakage characteristics, and leakage severity. Different clinically relevant leakage groups have been defined. Efficacy of different treatment strategies adjusted for leakage severity will be analyzed in these clinical groups. The full study protocol is accessible at www.tentaclestudy.com.
Results: Detailed data of 1509 patients with AL was collected from 71 centers in 20 countries. Data accuracy was 96.5%. Preliminary results showed that the overall 90-day mortality was 11.7%. The analysis of TENTACLE – Esophagus data is currently being performed and efficacy of different leakage treatment strategies is being assessed. The efficacy of initial leakage treatment strategies will be ready to be presented at the WCES meeting.
Conclusion: This is the largest study on effectiveness of AL treatments. The final results of initial leak treatments, which will be available for presentation at the WCES meeting, could provide an evidence-based basis that can be used by clinicians to determine the preferred primary treatment strategy in patients with a given type of anastomotic leakage.
Upper GI—esophageal cancer
O043—Prognostic factors for mortality in patients with anastomotic leakage after esophagectomy for cancer
Sander Ubels1, M. Verstegen1, S. Bouwense2, G. Hannink3, P. Siersema4, B. Klarenbeek1, F. van Workum5, C. Rosman1, on behalf of the TENTACLE – Esophagus collaborative group
1Radboudumc, Surgery, 2Maastricht UMC + , Surgery, 3Radboudumc, Operating Rooms, 4Radboudumc, Gastroenterology and Hepatology, 5Canisius-Wilhelmina Ziekenhuis, Surgery, The Netherlands
Aims: Anastomotic leakage (AL) is a common and potentially life-threatening complication after (minimally-invasive) esophagectomy. In patients with AL it is largely unknown which patient parameters and leakage characteristics are associated with leak severity and mortality. We aimed to identify prognostic factors for mortality in patients with anastomotic leakage after esophagectomy.
Methods: The TENTACLE – Esophagus study is an international retrospective cohort study, in which 1509 patients with AL after esophagectomy between 2011 and 2019 were included in 71 centers from 20 countries. Potential prognostic factors were selected from literature and a hypothetical association with mortality. Confounders of (individual) prognostic factors were identified using a directed acyclic graph approach to minimize bias. Primary outcome was 90-day mortality. Logistic regression analysis was performed to estimate crude and adjusted odds ratios (AOR) and 95% confidence intervals (95%CI). The study protocol is accessible at www.tentaclestudy.com.
Results: Overall 90-day mortality rate was 11.7%. Leakage characteristics with the largest prognostic effect on mortality were gastric conduit ischemia/necrosis (AOR 2.32, 95%CI 1.51–3.57), defect circumference ≥ 25% (AOR 2.12, 95%CI 1.34–3.36) and intrathoracic fluid collections (drained AOR 2.15, 95%CI 1.16–4.00; undrained AOR 2.44, 95%CI 1.60–3.72). Patient parameters with the largest prognostic effect were ASA-score ≥ 3 (AOR 4.20, 95%CI 1.67–10.59), ECOG-score ≥ 2 (AOR 2.79, 95%CI 1.58–4.92) and respiratory failure (AOR 3.59, 95%CI 2.50–5.15), hemodynamic failure (AOR 2.97, 95%CI 1.93–4.57) or renal failure (AOR 3.68, 95%CI 2.00–6.79) at time of AL diagnosis. Resection approach (i.e. open, minimally-invasive, hybrid or robot-assisted) was not identified as a prognostic factor for 90-day mortality in patients with AL.
Conclusion: Defect circumference, intrathoracic fluid collections, gastric conduit condition and several patient parameters were identified as prognostic factors for mortality in patients with AL. Adjusting for these prognostic factors may reduce confounding bias in future studies assessing efficacy of AL treatments. The identified prognostic factors contribute to the understanding of the severity of anastomotic leakage after esophagectomy and may be used to recognize the severity of an anastomotic leak in individual patients.
Upper GI—esophageal cancer
O044—Post-esophagectomy tracheobronchoesophageal fistula: risk factors and treatment strategies analysis from a single high-volume institution experience
Paolo Parise, E. Talavera Urquijo, A. Cossu, F. Puccetti, S. Battaglia, U. Elmore, L. Barbieri, R. Rosati
"San Raffaele" Hospital, Gastrointestinal Surgery Unit, Italy
Aims: tracheobronchoesophageal fistula (TBEF) after esophagectomy is a rare but severe complication. The incidence varies between 0.28% and 3.9% in the literature and the morbidity and mortality rates are high (57.1%). Aims of the present study were the identification of risk factors of this complication and review the treatment strategies in a single high volume center.
Methods: Patients who developed a TBEF after esophagectomy in our institution between January 2014 and February 2020 were retrospectively identified from a prospectively collected electronic database. Baseline, intraoperative, postoperative, TBEF details and main outcomes were analyzed. A univariate analysis was performed to compare the evaluated variables with the overall sample to identify predictors and causes of TBEF.
Results: Out of 514 esophagectomies performed in the study period, 16 TBEF patients were identified and formed our study population. The median time for TBEF diagnosis was 13 postoperative days (POD) (9–29), while the median time for anastomotic leakage presentation was slightly earlier at 7.5 POD (5–11). The majority of TBEFs (50%) developed as a result of an anastomotic leak, while 6 of 16 cases (37.5%) showed also ischemic changes around the airway defect. The remaining two cases (12.5%) developed because of an esophageal stent decubitus. 14 patients (87.5%) were treated with upfront surgery, one was treated conservatively, and one endoscopically. Primary suturing repair and additional intercostal muscle flap interposition was the most performed surgical technique (68.75%). Multiple surgeries were often required. Overall, surgery achieved a survival rate of 62.5% and an oral intake resumption rate at discharge of 43.75%. Overall mortality was 37.5% but among those with a defect size larger than 1 cm was 50%.
At univariate analysis the only parameter predictive for a TBEF development resulted the presence of an anastomotic leak (19.7% vs. 100%, p = 0.000). The adoption of a minimally invasive approach, neoadjuvant treatments, lymphadenectomy extent resulted not significantly associated.
Conclusions: TBEF after esophagectomy is an uncommon but serious life-threatening condition. Its association with anastomotic leak is high and seems to be the main cause for its development, even if ischemia may play an important role. A prompt surgical treatment is the cornerstone for a successful outcome.
Upper GI—esophageal cancer
O045—Short-term outcome for high-risk patients after esophagectomy
Victor Plat1, W. Stam1, B. Bootsma1, J. Straatman1, T. Klausch2, D. David1, D. van der Peet1, F. Daams1
Amsterdam UMC, 1Gastrointestinal surgery, 2Epidemiology and biostatistics, The Netherlands
Introduction: A transthoracic esophagectomy (TTE) facilitates mediastinal dissection, however it has a significant impact on cardiopulmonary status. High-risk patients may therefore be better candidates for transhiatal esophagectomy (THE) in order to prevent serious complications. This study addresses short-term outcome following TTE and THE in patients that are considered to have a higher risk of surgery-related morbidity.
Methods: This population-based study included patients who underwent a curative esophagectomy between 2011 and 2018, registered in the Dutch Upper GI Cancer Audit. The Charlson comorbidity index was used to assign patients to a low-risk (score ≤ 1) and high-risk group (score ≥ 2). Propensity score matching was applied to produce comparable groups between high-risk patients receiving TTE and THE. Primary endpoint was mortality, secondary endpoints included morbidity and oncological outcomes. Additionally, a matched subgroup analysis was performed, including only cervical reconstructions.
Results: Of 5438 patients, 945 and 431 high-risk patients underwent TTE and THE respectively. After propensity score matching, postoperative mortality (6.3% vs 3.3%, P = 0.050), overall morbidity, Clavien-Dindo ≥ 3 complications, pulmonary complications, cardiac complications and re-interventions were significantly more observed after TTE compared to THE. A significantly higher mortality after TTE with a cervical reconstruction was found compared to THE (7.0% vs 2.2%, P = 0.020).
Conclusion: Patients with a high Charlson comorbidity index predispose for a complicated postoperative course after esophagectomy, this was more outspoken after TTE compared to THE. In daily practice these postoperative outcomes should be balanced with the lower lymph node yield, but comparable positive node count and radicality after THE.
Upper GI—gastric cancer
O158—Endoscopic submucosal dissection (ESD) and robotic sentinel node navigation surgery (SNNS) for the treatment of early gastric cancer (ECG)
Andrea Bottari, L. Fortuna, S. Buccianti, G. Barbato, C. Agostini, F. Giudici, F Cianchi, F Staderini
AOU Careggi, Chirurgia dell'apparato digerente, Italy
Aims: Early gastric cancer (EGC) is defined as a cancer limited to mucosa (T1a) and submucosa (T1b). The 5-year survival rates are respectively 96% and 83% for T1a and T1b. Despite endoscopic submucosal dissection (ESD) is considered the standard treatment for EGC, literature reports a quite considerable rate of lymph-node metastasis (2% to 18%). Combined surgical-endoscopic treatment can achieve accurate resection of EGC, solving the problem of lymphadenectomy which cannot be performed endoscopically. Near infrared (NIR) fluorescence imaging with indocyanine green (ICG) was recently introduced for lymphatic mapping in several tumors. The aim of the study is to evaluate the feasibility and safety of ESD in combination with robotic ICG guided sentinel node navigation surgery (SNNS).
Methods: ICG was endoscopically injected intraoperatively into the submucosal layer around the tumor. Intraoperative NIR imaging with ICG was carried out with a near-infrared camera system built into the robotic platform. The first lymph node which had taken up ICG appeared as a green spot and was identified as the sentinel node (SN). SN was then sent for extemporaneous histopathological examination. When ICG fluorescence extended to the second nodal stations a ICG guided robotic basin lymphadenectomy was performed. Basin lymph nodes were sent for definitive histopathological analysis. If no tumoral cells were identified in the SN, an endoscopic ESD with standard technique was conducted. If the SN pathological examination revealed tumoral cells, a robotic radical resection and D2 lymphadenectomy was completed.
Results Seven ESDs with SNNS and basin lymphadenectomy basin were performed. No gastric perforations or other intraoperative complications were registered. Mean operative time was 148,6 min. All the procedures histologically resulted in complete excisions. No lymph nodes metastasis was demonstrated in either the SN or the basin lymph nodes. A mean of 12 lymph-nodes was collected. Mean hospitalization time was 2,8 days.
Conclusions In our preliminary experience, combined ESD and SNNS could be recommended as a safe and effective treatment for EGC in patients with potential risk of LN metastasis or in patients with multiple comorbidity in order to avoid more invasive organ resections.
Upper GI—gastric cancer
O159—Feasibility of laparoscopic gastrectomy for locally advanced gastric cancer in the elderly
Hender Hernandez, R. Olarte, W. Galvis, G. Labrador
Erasmo Meoz University Hospital, Norte de Santander, Colombia
Introduction: It has been 26 years since Kitano et. al, published the first report of laparoscopic total gastrectomy in a patient with early gastric cancer (GC) (1), and the use of this technique has been increasing gradually. Multiple clinical trials have compared laparoscopic gastrectomy (LG) with open gastrectomy (OG) in the treatment of gastric cancer, finding similar outcomes in mortality and without significant differences in serious adverse events (2). LG possibly benefits patients with GC by reducing the length of hospital stay, post-surgical morbidity (3,4,5) and is similar to open gastrectomy concerning the quality lymphadenectomy(5,6,7,8). Despite the technical challenge, LG with D2 lymphadenectomy (9–10) is considered a feasible and safe procedure for the treatment of locally advanced gastric cancer (9,11,12,13,14,15), even when performed in elderly patients or with high body mass index (BMI) (16).
Gastric cancer is the third cause of cancer mortality in the world (17) and in Colombia it is considered the first, affecting mainly low-income, elderly and urban people (18–19). In general, gastric cancer is diagnosed in Latin America by upper digestive tract endoscopy at advanced stages, possibly due to the low use of screening tests (20). In the West and specifically in Latin America there are little published studies that describe surgical and oncological outcomes in patients with with LG for advanced gastric cancer (24).
Aims: Our objective was to compare the short-term perioperative outcomes of LG in adults vs elderly patients with locally advanced gastric cancer. We also studied the variables correlated with hospital stay.
Methodology: The Erasmo Meoz University Hospital is a reference center in the Northeast region of Colombia and offers minimally invasive surgery for the management of gastric cancer since October 2014. We selected for our retrospective observational study 116 patients attended consecutively from November 2014 to December 2018.
Results: 1. Demographic characteristics: During the study period 116 participants were included. The median age was 64 years, 51 (44%) patients were 65 years or older. The tumor was visible on the preoperative CT scan in 105 (91%) patients, 41% located in the body and 41% in the antrum. 2. Surgical: Of the procedures, 90 (78%) were total laparoscopic gastrectomies and 26 (22%) were subtotal. The mean operative time was 256 min and the hospital stay was 10 days. There were no reports of intraoperative successes. All patients had Roux-in-Y reconstruction. The mean number of total lymph nodes resected was 25, with 8 lymph nodes classified as affected. 3. Oncological: More than half of the patients had tumors classified as intestinal adenocarcinoma. Only 3% of the tumors corresponded to adenocarcinoma with signet ring cells. Ten tumors could not be classified histologically. The low grade of tumor differentiation was the most frequent, followed by moderate and high respectively. When comparing the tumor stages in patients younger than 65 years with those aged 65 years or older, we did not find statistically significant differences. 4. Complications: Four procedures required conversion, three due to local infiltration and one due to the presence of adhesions secondary to a previous abdominal procedure. 11% of the patients presented with a medical complication, atelectasis and pneumonia beeing the most common. Surgical complications that required reoperation occurred in 5% of the patients, the hemorrhagic complication being the most frequent. 5. Comparison between adults and elderly patients: When a comparison of LN findings was made between adults and elderly patients, a median operative time (minutes) of 240 vs. 240 (p > 0. 05), median of macroscopic resection margins (cm) of 6 vs. 5 (p > 0.05), a median of dissected lymph nodes of 25 vs. 19 (p > 0.05) and a median number of positive lymph nodes of 4 vs. 3 (p > 0.05), Likewise, the general rate of postoperative complications did not differ significantly between adults and elderly patients (7 and 11 respectively) (p > 0.05). We did not observe significant differences in the rates of minor complications (Clavien-Dindo grade II) and serious complications (Clavien-Dindo ≥ IIIa) between both cohorts (3–5% vs. 6–12% (p > 0 0.05); 3–5% vs. 4–8%, (p > 0. 05)). 6. Hospital stay: The median hospital stay was 7 days in both groups, with no statistically significant difference (p > 0. 05). When analyzing in multiple linear regression with adjusted R-squared value of 0.4783, residual error of 5.693 and 108 degrees of freedom, the authors found that medical complications (p = 0.001), surgical (p < 0.0002), comorbidities (p = 0.02), and previous use of anticoagulants (p = 0.002), were correlated by 48% with changes in the variability of hospital stay (p value < 0.0002). When evaluating the model with a significance level of 0.05, this model did not satisfy the assumption of homoscedasticity and Kurtosis.
Conclusions: We found no statistical differences in short-term outcomes between elderly and adult patients with locally advanced gastric cancer treated with laparoscopic gastrectomy. This technique is safe and feasible in elderly, and it might be performed at high-volume centers by trained surgical teams. LG offers a safe and effective therapeutic option, and is superior in terms of operative morbidity and potentially superior in terms of oncological outcomes for surgically resectable advanced gastric cancer. Given the absence of local research on LG as a treatment for advanced gastric cancer, our study is of marked importance, allowing us to evaluate the feasibility and safety of this procedure carried out in adults and older adults with this pathology and can be used for future research. The outcomes evaluated are short-term.
Upper GI—gastric cancer
O160—Laparoscopic conversion gastrectomy: an effective and safe treatment mMethod for initially unresectable gastric cancer
Soon Jae Kwon1, HH Kim2, DJ Park2, YS Suh2, SH Ahn2, YS Park2, SJ Lee1, SH Kang1
1 Seoul National University Bundang Hospital, Department of Surgery, 2Seoul National University Bundang Hospital / Seoul National University College of Medicine, Department of Surgery, Korea.
Background: Conversion surgery(CS) is a treatment aiming at R0 resection after chemotherapy in initially unresectable tumors. The effect of CS in gastric cancer is not well known.
Aims: The aim of the study is, to provide a basic cornerstone of conversion surgery, especially those done in laparoscopic method, for stomach cancer by a case series of conversion surgery conducted in our center.
Methods: We reviewed the medical records from 2003.6.23. to 2020.10.27, and 40 cases were selected in which CS for stomach cancer was conducted.
Results: Among 40 patients, 37 (92.5%) patients underwent R0 resection. 21 (52.5%) patients underwent laparoscopic gastrectomy. Most patients underwent subtotal or total gastrectomy excluding 2 cases, which were proximal gastrectomy and segmental resection.
The most common pathologic ypTNM stage was stage IV, meaning pathologic M1 even after the chemotherapy, though those metastatic lesions were resected through R0 resection in most cases. In 5 cases, there were no residual tumor, or pathologically complete response.
Of the 40 cases, 23 cases recurred since now. The most common recurrence site was distant lymph node (9 cases, 22.5%), followed by the peritoneal seeding (7 cases, 17.5%). The median recur-free survival (RFS) was 14.8 months with median follow-up period of 12.3 (0.9 – 106.0) months.
There were 9 (22.5%) cases with early complication, of which 5 (12.5%) cases were those with complications of Grade IIIA or higher in the Clavien-dindo classification.
There was no significant difference of RFS (P = 0.747) or complication rate (P = 1.000) between open, laparoscopic, and open conversion CS. Also, laparoscopic surgery was not a negative prognostic factor for RFS (HR 0.442; 95% CI 0.175–1.115; P = 0.084) nor complication rate (hazard ratio[HR] 1.042; 95% confidence interval[CI] 0.203–5.343; P = 0.961). Multivariable analysis showed that ypT stage (HR 12.361; 95% CI 1.533–99.699; P = 0.018) is the only independent and meaningful prognostic factor for RFS.
Conclusion: The laparoscopic conversion surgery after neoadjuvant or palliative chemotherapy may be the safe and effective method of curation for initially unresectable stomach cancer.
Upper GI—gastric cancer
O161—Effects of tissue sealants for prevention of postoperative pancreatic fistula after laparoscopic gastrectomy: a propensity score matching analysis
Ji-Jung Jung1, Y.S. Suh2, S.H. Kang1, S.J. Lee1, Y. Won1, Y.S. Park1, S.H. Ahn1, H.H. Kim2
1Seoul National University Bundang Hospital, Department of Surgery, 2Seoul National University College of Medicine, Department of Surgery, Korea
Objective: Postoperative pancreatic fistula (POPF) is one of the most worrisome complication after gastric cancer surgery with lymph node dissection. This study aims to evaluate the effectiveness of tissue sealants in prevention of pancreatic fistula after laparoscopic gastrectomy for gastric cancer.
Methods: A total of 286 patients with gastric cancer who underwent laparoscopic gastrectomy in Seoul National University Bundang Hospital between January 2019 and July 2020 were retrospectively analyzed. Patients were dichotomized into sealant and non-sealant groups depending on the intraoperative use of tissue sealants. Clinical characteristics and postoperative outcomes were compared after 1:3 propensity score matching (PSM) with age, sex, BMI, American Society of Anesthesiologists (ASA) score, preoperative history of anticoagulant therapy, tumor stage, operation type, operation time, extent of lymph node dissection and the number of retrieved lymph nodes as covariates.
Results: PSM resulted in 94 patients with sealants and 44 without sealants. The majority of patients were diagnosed with early gastric cancer (75.6%), and AGC accounted for 24.6%. There were no significant differences of POPF (6.4% vs. 4.5%, p = 0.968) nor ascites amylase level (271.0 ± 311.5 vs. 385.6 ± 487.7, p = 0.158) at postoperative day 2 (POD2) between sealant and non-sealant groups (Figs. 1–2). Also, there were no significant differences of overall complication (11.7% vs. 9.1%, P = 0.868) nor complication with ≥ Clavien-Dindo III (5.3% vs. 2.3%, p = 0.711) between sealant and non-sealant group. However, sealant group had a lower level of POD2 white blood cell count (11,716.1 ± 3983.3 vs. 10,099.7 ± 2642.4, p = 0.017) and C-reactive protein (13.2 ± 7.3 vs. 9.4 ± 5.6, p = 0.004, respectively).
Conclusion: Tissue sealants could not reduce any complication including pancreatic fistula during laparoscopic gastrectomy with lymph node dissection, especially for early gastric cancer.


Upper GI—gastric cancer
O162—are minimally invasive techniques in gastrectomy for cancer associated with textbook outcomes and survival?
Sivesh Kamarajah1, Sheraz Markar2, E. Griffiths1, A. Phillips3, J. Ruurda4, R. van Hillegersberg4, W. Hofstetter5
1Queen Elizabeth Hospital Birmingham, University Hospitals Birmingham NHS Trus, Department of Upper Gastrointestinal Surgery, 2Imperial College London, London, United Kingdom, Department of Surgery & Cancer, 3Royal Victoria Infirmary, Newcastle University Trust Hospitals, Northern Oesophagogastric Unit, United Kingdom. 4University Medical Center Utrecht, University Utrecht, Department of Surgery, The Netherlands. 5The University of Texas MD Anderson Cancer Center, Thoracic and Cardiovascular Surgery, USA
Introduction: Robotic gastrectomy is internationally gaining wider adoption, yet the impact of learning curve of this new technique on textbook outcomes remains unquantified. This population-based cohort study aimed to compare rates of textbook outcomes from minimally invasive techniques for gastrectomy for gastric adenocarcinoma.
Patients and Methods: Data from the National Cancer Database (NCDB) from the United States from 2010 to 2017, was used to identify patients with non-metastatic gastric adenocarcinoma receiving either open (OG, n = 22,183), laparoscopic (LAMIG, n = 6,359) or robotic (RAMIG, n = 1,718) gastrectomy. Textbook outcomes were defined as margin negative resections, lymph node harvest 15, length of stay 21 days, no 90-day mortality and no 30-day readmissions. Multivariable logistic regression and Cox analyses were used to account for treatment selection bias.
Results: Patients receiving RAMIG were from high volume, academic centers, private insurance, higher medical income and with advanced clinical T and N stage disease. From 2010 to 2017, the rates of textbook outcomes increased for OG (34% to 48%), LAMIG (41% to 53%) and RAMIG (38% to 57%). Patients receiving RAMIG had significantly higher rates of textbook outcomes compared to OG and LAMIG (52% vs 39% vs 48%, p < 0.001), which remained on logistic regression analysis for both LAMIG (OR: 1.19, p < 0.001) and RAMIG (OR: 1.30, p < 0.001) compared to OG. On Cox analyses, textbook outcomes (HR: 0.58, p < 0.001) and patients receiving both LAMIG (HR: 0.89, p < 0.001) and RAMIG (HR: 0.88, p = 0.006) were independent prognostic factors associated with long-term survival.
Conclusion: Despite in early stages of learning curve amongst surgeons, both LAMIG and RAMIG is associated with improved textbook outcomes and long-term survival. Therefore, wider adoption of minimally invasive techniques for gastric cancers are warranted owing to improved patient benefit.
Upper GI—gastric cancer
O163—Short-term outcomes of single-incision distal gastrectomy and conventional totally laparoscopic distal gastrectomy – a randomized controlled trial
So Kang, S.J. Lee, Y.S. Park, S.H. Ahn, Y.S. Suh, H.H. Kim
Seoul National University Bundang Hospital, Surgery, Korea
Introduction: Surgical skills and devices have evolved to a level that allowed the paradigm in minimally invasive surgery is to shift towards patient quality of life (QOL) and satisfaction. Such innovations allow technically demanding procedures such as single-incision distal gastrectomy (SIDG) to become more feasible. However, there have been no reports of a randomized trial comparing SIDG to multi-port gastrectomy. This study evaluates the postoperative outcomes and patient QOL of SIDG compared to conventional totally laparoscopic distal gastrectomy (TLDG).
Methods: This study was designed as a prospective phase II randomized controlled study. Patients diagnosed with early gastric cancer in the distal 2/3rd of the stomach were randomized to either TLDG or SIDG group. All operations were performed by a single surgeon. Primary endpoint was pain score using the visual analogue scale on postoperative day (POD) 1. Other outcomes include operative data, complications, and patient QOL using the European Organization for Research and Treatment of Cancer C-30 and STO22 modules.
Results: A total of 43 patients were enrolled to each group from September 2017 to February 2020. There was no statistical difference in age, sex, body mass index, and comorbidity score. Mean operation time was 157.4 ± 53.5 min in the TLDG group and 148.9 ± 50.1 min in the SIDG group (p = 0.445). There was no difference in POD1 pain scores between the two groups (TLDG. = 3.5 ± 0.8, SIDG = 3.4 ± 1.0, p = 0.818). No additional trocars were used in the SIDG group, and there was no conversion to an open procedure in both groups. One (2.4%) patient in each group had a postoperative complication that needed invasive intervention. Mean hospital stay was 6.2 ± 2.1 days in the TLDG group and 6.3 ± 2.8 days in the SIDG group (p = 0.829).
Conclusion: There was no difference in POD1 pain scores between SIDG and TLDG. SIDG did not increase short-term morbidity compared to TLDG.
Upper GI—gastric cancer
O208—Body composition is a predictor for postoperative complications after gastrectomy for gastric cancer; a prospective side-study of the LOGICA-trial
Thaís Tweed1, A van der Veen2, S. Tummers1, D. van Dijk1, M. Luyer3, G. Nieuwenhuijzen3, J Ruurda2, R. van Hillegersberg2, J. Stoot1, LOGICA study group
1Zuyderland Medical Center, Department of Surgery, 2University Medical Center Utrecht, Department of Surgery, 3Catharina Hospital, Department of Surgery, The Netherlands
Background: This study aimed to evaluate the effects of body composition on postoperative complications after gastrectomy in a Western population with predominantly advanced gastric cancer.
Methods: For each patient in the LOGICA trial, a multicenter randomized trial on laparoscopic versus open gastrectomy for gastric cancer, the preoperative abdominal CT-scan closest to gastrectomy was collected and used to calculate 6 body composition variables: the mass (M) and radiation-attenuation (RA) of skeletal muscle, visceral adipose tissue and subcutaneous adipose tissue (SM-M, VAT-M, SAT-M, SM-RA, VAT-RA and SAT-RA). RA indicates the radiodensity in Hounsfield Units; a lower RA in adipose tissue is associated with increased tissue triglyceride concentration. These 6 continuous body composition variables were expressed as Z-scores, depicting how many standard deviations each patient’s CT-value differs from the sex-specific mean value of the study sample. The primary analyses included patients that underwent preoperative chemotherapy and gastrectomy. The 6 body composition scores were associated with the occurrence of severe postoperative complications (Clavien-Dindo grade ≥ 3b).
Results: From February 2015 to August 2018, 214 patients received a gastrectomy in the LOGICA trial, of whom 166 were included in the current study. A total of 112 patients received preoperative chemotherapy. In these patients, a high SM-M Z-score was associated with a lower risk of severe postoperative complications in multivariable analysis (RR 0.47, 95% CI 0.28–0.78, p = 0.004). Furthermore, high VAT-RA Z-scores and SAT-RA Z-scores were associated with a higher risk of severe postoperative complications in multivariable analyses (RR 2.82, 95% CI 1.52–5.23, p = 0.001 and RR 1.95, 95% CI 1.14–3.34, p = 0.015, respectively). VAT-M, SAT-M and SM-RA showed no significant associations.
Conclusion: Preoperative low skeletal muscle mass and a high visceral and subcutaneous adipose tissue radiation attenuation (indicating low triglyceride concentration) were associated with a higher risk of developing a severe postoperative complication in patients treated with preoperative chemotherapy and gastrectomy.
Upper GI—gastroduodenal diseases
O117—8 Pictures worth a thousand words—an audit of photodocumentation compliance with the BSG/AUGIS guidelines
Tom Vincent McIntyre, W. Duggan, N. O'Sullivan, J. Tyrell, E. Burke, K. Schmidt
Wexford General Hospital, Department of Surgery, Ireland
Aims: Oesophago-gastric-duodenoscopy (OGD) is the diagnostic gold standard investigation for pathologies of the upper gastrointestinal tract. However, lesions may be missed due to inadequate technique and failure to visualise all mucosal surfaces. At present, there is no agreed global photo-documentation protocol. The British Society of Gastroenterology (BSG) and Association of Upper GI surgeons of Great Britain and Ireland (AUGIS) guidelines, published in Sept 2017, recommend photo-documentation of eight anatomical landmarks during OGD: upper oesophagus, lower oesophagus, fundus, gastric body, incisura, antrum, duodenal bulb, distal duodenum.
Methods: Retrospective review of electronic OGD reports. Inclusion criteria: all elective OGDs with electronic reports performed between April 4th and June 28th 2019. Exclusion criteria: emergency, therapeutic OGDs. Recorded data: patient demographics, endoscopist specialty, indication, number of photos, anatomical sites photographed, pathology, pathology identified and whether photographed.
Results: 22 OGDs (11%) were fully compliant with the guidelines. The oesophagoagstric junction, second part of the duodenum and the fundus were the most commonly photographed (95%, 90% and 88.5% respectively). The incisura was the most commonly missed being photographed only 26.5% of the time. 26% of OGDs had only photographic evidence of four of the eight landmarks. Where the indication for OGD was dysphagia only 33% of OGDs had photodocumentation of the upper Oesophagus.
Conclusions: We found an overall poor compliance with the BSG/AUGIS guidelines. We have completed an education session on the importance of high quality OGDs in the diagnosis of UGI malignancy and are gathering data to complete the audit loop at present.
Upper GI—Reflux-Achalasia
O125—Predictors of patient satisfaction after laparoscopic fundoplication. A multicentre cohort study
Piotr Myśliwiec1, M. Bobowicz2, W. Makarewicz3, H. Razak Hady1, M. Pedziwiatr4, M. Migaczewski4, G. Wallner5, M. Raban5, W. Kupczyk6, M. Witzling7, R. Ostaszewski8, P. Sroczynski9, M. Michalik10
1Medical University of Bialystok Clinical Hospital, 1st Department of General and Endocrine Surgery, 2Medical University of Gdansk, Department of Surgical Oncology, 3Specialist Hospital in Koscierzyna, Department of General Surgery and Surgical Oncology, 4Jagiellonian University Medical College, 2nd Department of General Surgery, 5Medical University of Lublin, 2nd Department of General, Gastrointestinal and Oncological Surgery of the Alimentary Tract, 6Collegium Medicum Nicolaus Copernicus University, Department of General, Gastroenterological and Oncological Surgery, 7Ceynowa Hospital, Department of General and Oncological Surgery, 8Municipal Hospital in Hajnówka, Department of General and Laparoscopic Surgery, 9Military Institute of Medicine, Department of General, Oncological, Metabolic and Thoracic Surgery, 10University of Warmia and Mazury in Olsztyn, Department of General, Minimally Invasive and Elderly Surgery, Poland
Anti-reflux procedures are controversial due to poor-quality evidence of balance between the benefits and procedure specific morbidity.
The aim of this study was to assess patients’ satisfaction with laparoscopic fundoplication and objective predictors of this decision based on the patients’ baseline characteristics, and treatment outcomes.
This multicentre observational study was carried out in nine Polish laparoscopic centres on 330 patients who underwent laparoscopic fundoplication 2009–2019. Parameters assessed included: centre, date of surgery, patient’s gender, age, BMI, ASA score, smoking status, preoperative assessment, Los Angeles gastroscopy score, indication (GERD + hiatal hernia v hiatal hernia), type of hiatal hernia, symptoms and their duration, type of medical treatment and its duration, surgical technique, crural suturing, conversions and their reasons, length of operation, intra, perioperative and late morbidity, mortality, re-interventions, long term follow-up, re-hospitalizations, re-do surgery, medication and a question if patient would agree to undergo the same surgery. Based on the provision, that the study design did not incorporate any medical intervention, the Ethics Committee approval was not required. Statistical analysis was performed using STATISTICA 13.0 Univariate and multivariate logistic regression models were built. Statistical significance was established at the level of alpha error of < 0.05.
Most (86,1%) patients would agree to undergo laparoscopic fundoplication again (group I—Yes), while 13,9% of all patients would not agree to be subjected to such surgery again (group II—No). In the Group II (No) there were significantly more patients with perioperative complications as compared to the Group I (Yes) (30.4% vs 15.8%); late complications (26% vs 7%), especially permanent dysphagia (6.5% vs 0.4%); and the need of late re-interventions (19.6% v 4.2%). Univariate analysis pointed to factors deterring patients from anti-reflux surgery: late complications (OR 6.96) return to anti-acid medication (OR 3.15), female gender and extra-esophageal symptoms as an indication to surgery.
Need for medication for GERD symptoms preoperatively made patients 4.5 times more satisfied, and heartburn during the night – twice more prone to undergo the surgery again than those without this symptom.
In multivariate analysis, late complications and return to anti-acid medication were the most important factors, deterring patients from undergoing the same procedure with (OR 5.43 and 2.48, respectively). Heartburn during the night made patients more satisfied with the operation (OR 0.36).
Late complications, and return to anti-acid medication are the two most important factors negatively influencing patients’ experience. On the contrary, preoperative nocturnal heartburn had a positive impact on patients’ satisfaction.
Upper GI—Reflux-Achalasia
O126—Study of the crural tension during laparoscopic antireflux operation
Viktor Grubnyk1, V.V. Grubnik1, M.R. Paranyak2, V.V. Ilyashenko1
1Odessa National Medical University, Surgery, 2Danylo Halytsky Lviv National Medical University, General Surgery, Ukraine
According to recent studies, a high rate of hiatal hernia (HH) recurrences is associated with suturing the crura of the diaphragm together under tension; therefore, tension-free crura repair has become the standard. During the operation, it is difficult for a surgeon to assess objectively the force of tension of the crura only by visual criteria or the presence of splitting of the crus muscles without special measuring instruments.
Our aim was to assess the relationship between the force of the tension of crural closure and recurrence rate of HH. In addition, to compared the effectiveness of mesh implants in patients depending on crural tension.
Materials and methods: A total of 69 patients underwent measurement of the force of tension of crural closure during HH repair. Depending on the force of tension, patients were divided into two groups. Thirty patients with crural tension < 4 N were included in the first group. The second group included 39 patients with crural tension greater than 4 N. The index 4 N was chosen because of the data of our previous study where were establish the correlation between > 4 N crural tension force and rate of HH recurrences during simple cruroraphy. The decision to use mesh for HH repair was made randomly in each group with ratio 1:1. All patients were assessed using endoscopy, barium-swallow study, 24—h pH monitoring, validated symptoms and quality of life (GERD-HRQL) questionnaires.
Results: The medium age of patients and body mass index did not differ significantly between the groups. There was no conversion to open procedure or mortality in the both groups. The medium follow-up was 12 (6–18) months. During the follow up, 7 (17,95%) recurrences occurred in the group II (2 in subgroup with mesh vs 5 in subgroup without mesh, p < 0,01). It was observed 2(6,66%) recurrences in the group I (2 in subgroup without mesh). The total reoperation rate was 7%. Patient satisfaction and improvement in GERD-HRQL score were significantly higher in the mesh subgroups (p = 0.004).
Conclusion: Measuring the tension of crural closure is effective new method that makes it clear the tactics of the operation. Our study showed that crural closure tension more than 4 N can be indication for the use of mesh implants.
Upper GI—Reflux-Achalasia
O127—Indocinine green-fluorescence in robot-assisted esophageal myotomy for achalasia
Pasquale Campagna, Graziano Pernazza, R. Mancini, L. Ioni, T. Picconi, C. Montanari, M.G. Galotti
AO San Giovanni Addolorata Hospital / Robotic General Surgery Unit, Surgery, Italy
Aims: The objective of this study is to evaluate the role of intraoperative use of indocyanine green (ICG) to increase accuracy of myotomy and to evaluate mucosal integrity as an alternative mean to intraoperative gastroscopy.
Methods: Since we started to perform robot-assisted surgery for achalasia in 2016 we recruited a 34 consecutive patients series (19 female and 15 male). In the cases 1 to 14 (A series) we routinely performed intraoperative endoscopy at the end of myotomy. Since then we abandoned intraoperative endoscopy and started using ICG as an alternative method to evaluate mucosal integrity and residual muscular fibers, thus injecting intravenously a bolus of 4 ml of ICG (1,6 mg/ml) and under fluorescence we evaluated the inflow, persistence and outflow of the ICG in cases 15 to 34 (B series). Population carachteristics were: age (53 years old, 48—57), according to Chicago classification there were 50% (17pts, 7 in group A vs 10 in group B) affected by type I achalasia, 41,17% (14 pts, 6 in group A vs 9 in group B) affected by type II and 8,82% (3 pts, 2 in group A vs 1 in group B) affected by type III. In all the case was performed a robotic-assisted esophago-gastric myotomy and Dor partial anterior fundoplication.
Results: In our series we never experienced any mucosal injury during dissection. In case 14, after endoscopy, we found a small mucosal tear. We performed ICG for the first time in that case to evaluate the utility of this method and avoid intraoperative endoscopy.
In our series we had 1 patient with a small mucosal injury (2,94%) evident after endoscopy (Fig. 1 : A. small tear (white light); A'. ICG leak (fluorescence); B. small tear (white light after 20"); B'. margin hypoperfusion (after 20"). ICG made more evident the small tear which was solved closing by stitches the small defect without any modification of the postoperative course which was regular and uneventful.
In cases 15 to 34 no tears or ischemical areas were found and no gastroscopy was performed without further complications. In three cases, ICG made possible to better recognize residual fibers and to complete the myotomy (Fig. 2. A. mucosa; B. residual fibers; C. myotome margin). No relapse of pathology or adverse effect were recorded.
Conclusions Small tear may be caused by traction or energy diffusion and may be extremely small and difficult to be identified. In our experience intraoperative ICG-fluorescence resulted a simple and effective method to evaluate any mucosal injury without the use of a gastroscopy reducing potential complications, operative time and costs. Moreover this method allows to improve the identification of residual fibers making possible a more accurated myotomy preventing possible relapse of disease.


Upper GI—Reflux-Achalasia
O128—A prospective randomized trial on laparoscopic Nissen vs Toupet fundoplication in patients with atypical symptoms of gastroesophageal reflux disease
Mykola Paranyak1, V. Grubnyk2
1Danylo Halytsky Lviv National Medical University, General Surgery, 2Odessa National Medical University, Surgery # 3, Ukraine
Aim: To evaluate the clinical effect of laparoscopic Nissen fundoplication (LNF) and laparoscopic Toupet fundoplication (LTF) on laryngopharyngeal and respiratory symptoms in patients with gastroesophageal reflux disease (GERD) at long term follow-up.
Methods: One hundred and twenty patients with documented extraesophageal GERD symptoms were randomized to either undergo floppy Nissen (n = 60) or Toupet fundoplication (n = 60). Symptom scores of throat clearing, globus sensation, cough, throat pain, vocal changes were prospectively evaluated. To accurately document the improvement of extraesophageal symptoms, Reflux Symptom Index questionnaire was used. The quality of life was determined according to the LPR–HRQL questionnaire.
Results: There were no significant differences between the groups regarding demographic data such as age, gender or BMI. Thirty seven (30.8%) patients had pure extraesophageal manifestations of GERD while 83 (69.2%) reported combination of atypical and typical GERD symptoms. There were no conversion to open procedure and mortality in both groups. The median (interquartile range, IQR) total Reflux Symptom Index score before operation and at 24-month, 36-months, 48-months follow-up was 28.8 (12.4), 11.8 (10.8), 13.7 (11.4), 14.2 (12.12) in the LNF group and 26.9 (13.6), 13.0 (11.1), 14.5 (10.8), 15.7 (10.2) in the LTF group, respectively. The median (IQR) total LPR–HRQL score in the LNF group improved from 66.4 (19.3) before treatment to 14.2 (10.6) at 24 months, 14.4 (12.8) at 36 months, 16.4 (11.1) at 48 months. In the LTF group changes in the median (IQR) total LPR–HRQL score were as follows: 61.9 (16.6) – before treatment, 15.2 (11.7) at 24 months, 16.9 (12.6) at 36 months, 16.8 (12.8) at 48 months. At 48 months follow up, no differences were revealed between the treatment groups for overall satisfaction (88% vs 85%).
Conclusion: LNF as well as LTF provide excellent long-term results for patients with extraesophageal manifestations of GERD. In patients with presence of atypical symptoms of GERD, quality of life according to LPR–HRQL questionnaires is equivalent after LNF or LTF.
Upper GI—Reflux-Achalasia
O129—Mesh-related complications in the patients with large hiatal hernia
Viktor Grubnyk1, V.V. Grubnik1, M.R. Paranyak2, V.V. Ilyashenko1
1Odessa National Medical University, Surgery, 2Danylo Halytsky Lviv National Medical University, General Surgery, Ukraine
The purpose was to study the mesh related complications in the patients with the large hiatal hernia (HH).
Methods: We performed the retrospective study where we studied of mesh – related complications in the patients with the large HH who operated in our clinic for the period from 2000 to 2020 years. All complaints were recorded, the quality of life was determined according to the GERD-HRQL questionnaire.
Results: Out of 2490 operated patients with gastroesophageal reflux disease and HH in our clinic, 1200 patients had large HHs. In patients with large hernias, mesh implants were used in 692 cases to reinforcement crura repair. The following types of meshes were used: lightweight Ultrapro mesh, Parietex composite mesh, self-fixation mesh ProGrip, absorbable mesh Vicryl, polytetrafluoroethylene (PTFE) mesh with a nitinol framework. Mesh related complications were detected in 12 patients (1.73%). In 6 patients, dysphagia was observed due to ingrowth of the mesh into the tissue of the esophagus. 2 patients had chronic inflammatory process in the area of the mesh installation. One patient had a slight perforation of the esophagus with the formation of limited mediastinitis. Intraluminal mesh erosion occurred in 3 patients in whom PTFE was installed.
Redo operations were performed in all 12 patients. In 7 patients, the mesh was removed completely. In 1 patient, the mesh was removed and the mediastinum was drained. Leakage stop after 4 weeks. In 3 patients in whom migration of PTFE meshes into the esophageal lumen occurred, it was possible to remove endoscopically with the subsequent installation of special stents. Good results were obtained in 10 of 12 patients after reoperation. Dysphagia was observed in 2 patients after reoperation, which required repeated balloon dilation and stent placement in one case.
Conclusion: Non-absorbable meshes should be used with great care so that they do not come into contact with the esophagus. PTFE meshes with a nitinol frame should be prohibited and should not be used for repair of large HH.


Upper GI—Reflux-Achalasia
O131—Methods of quality assurance in multicentre trials in laparoscopic fundoplication for gastroesophageal reflux disease
Alexandros Andreou1, Lavinia Onos1, S.A. Antoniou2, N. Francis3
1York Teaching Hospital, NHS Foundation Trust, General Surgery, United Kingdom. 2Mediterranean Hospital of Cyprus, European University Cyprus. 3Yeovil District Hospital, United Kingdom
Background: Despite the extensive literature on laparoscopic anti-reflux procedures there is limited reporting on the quality assurance of the surgical technique. The aim of this study is to review the use of quality assurance tools and compare it to the current framework.
Methods: Medline, Embase, AMED, CINAHL, CENTRAL and OpenGrey databases were searched for randomized control trials comparing different methods of laparoscopic fundoplication for the management of gastroesophageal disease. Assessment of surgeon accreditation, the procedure standardization, and performance monitoring was conducted to evaluate the risk of performance bias.
Results: Forty -four publications reporting 29 randomized controlled trials were identified. Surgical experience and credentials were stated in only half of the studies. Standardization of the technique was reported in almost 70% whereas operative notes or video was submitted in one fourth of the studies. Finally, monitoring of the operative performance during the trial was undocumented in most of the trials (62%) as opposed to 4.2% of the studies that monitored the surgical technique.
Conclusion: Reporting of laparoscopic fundoplication techniques for GERD, does not comply with the current quality assurance framework. Future trials should apply a quality assurance framework of the surgical technique in order to increase the reliability of the studies.
Upper GI—Reflux-Achalasia
O132—THe new method of tension-free mesh repair for giant hiatal hernias
Andrii Malynovskyi, D.V. Korchevyi, I.I. Horbachuk
Odessa national medical university, Robotic and endoscopic surgery, Ukraine
Aims: For giant paraesophageal hernias, mesh repair is important option to prevent recurrence, but there is still no ideal prosthesis and technique of its placement to prevent complications. The aim of study was to analyze mid-term results of a new method of tension-free mesh repair for giant hiatal hernias.
Methods: Fourteen patients with giant hiatal hernia underwent laparoscopic repair using new technique. The mean age was 53,4 years (25–70). There were 9 women and 5 men. The mean BMI was 26.9 kg/m2 (16.4—31.2). The average hiatal surface area was 29.8 cm2 (range, 19,5—60). Mean distance between crura was 5.9 cm (range, 4.5 – 9.5 cm2). A round shaped polyester mesh with collagen coating Symbotex (Covidien) was used. The triangular patch was cut out of this mesh. A separate rectangular patch was cut out as well. This rectangular patch covered upper margin of the implant to enhance it and to prevent erosion of the esophagus. In the last 6 procedures we changed the method of constructing the mesh, using pentagonal patch and flexing twice its upper rectangular part. The patch was fixated by Prolene 2–0 suture. The mesh was fixated to the both crura using running non-absorbable V-loc suture.
Results: There were no conversions and intra-operative complications. The mean duration of procedure was 3 h (range, 2.5—4). The mean duration of hiatoplasty was 23 min (range, 15–40). There were no postoperative complications. Seven patients were assessed after a mean follow-up period of 14 month (range, 12–16) using questionnaires, endoscopy and barium swallow. There were no GERD recurrences and dysphagia or esophageal stenosis. There was 1 partial anatomical recurrence, symptomatic, with good effect of conservative treatment and no need for reoperation (7,1%). The rest of patients with follow-up period less than 12 months have no data for recurrences and dysphagia, and satisfied by the immediate results of surgery.
Conclusions: 1. The new method of tension-free repair using specially fashioned lightweight polyester mesh with collagen coating Symbotex (Covidien) showed feasibility. 2. The mid-term results of the new method showed no GERD recurrences and dysphagia and only 1 case of partial anatomical recurrence with no need for reoperation. 3. More cases collection with assessment of long-term results and comparing with other methods is needed.


Upper GI—Reflux-Achalasia
O133—The new technique of laparoscopic repair for hiatal hernia
Andrii Malynovskyi, D.V. Korchevyi, I.I. Horbachuk
Odessa national medical university, Robotic and endoscopic surgery, Ukraine
Aims: The technique of hiatal hernia repair is still debateful. For large and giant hernias mesh repair is recommended, but the search for the safest and most effective technique is ongoing. The aim was to access the mid-term results of a new technique called “internal buttress of posterior crural repair”.
Methods: From 2017 till 2020, 113 patients with type 1 hiatal hernias with mean distance between crura 4.6 cm (range, 3–5) underwent laparoscopic hiatal repair using the new technique. Mean age was 48.9 years (range, 22–78). There were 43 women and 28 men. After dissection of crura, 2 separated rectangular patches of Parietene Progrip mesh (Covidien) measuring 1 × 1.5–2.5 cm were attached to the posterior surfaces of the crura. The patches were fixated themselves by special hooks. Then, continuous two-lines suture was placed through both crura along with the patches using non-absorbable V-Loc 2–0 suture (Covidien). The same suture was used for Nissen fundoplication. 3D-laparoscopy was used while suturing (Epic 3DHD system, Wolf).
Results: All the procedures were performed successfully. There were no intraoperative complications. The mean duration of suturing facilitated by 3D-laparoscopy was 14 min (range, 8–25 min) for crural repair, and 9 min (range, 7–20 min) for fundoplication. Seventy one patients were assessed in a mean follow-up period of 18 month (range, 12–25) by questionnaires, endoscopy and barium swallow. There were no GERD recurrences and dysphagia or stenosis. There was 1 partial anatomical recurrence, symptomatic, with good effect of conservative treatment and no need for reoperation (1,4%).
Conclusions: 1. The new technique of internal buttress of posterior crural repair using small patches of Parietene Progrip mesh and V-loc suture showed feasibility and safety. 2. The use of 3D-laparoscopy facilitates suturing while performing hiatal repair and fundoplication. 3. Mid-term results showed no GERD recurrences and dysphagia, and only 1 case of partial anatomical recurrence with no need for reoperation. 4. More cases collection and long-term follow-up is needed to prove that the new technique can prevent both recurrence and mesh-related complications.


Poster presentations
Amazing technologies
P271—Machine Learning in enhancing the efficiency of the bariatric surgery pathway: A Novel Surgical Pathway Dashboard
Myutan Kulendran, Humza Malik, M. Adebibe, J. Mok, H. Malik, K. Devalia
Homerton University Hospital, Bariatric Surgery, United Kingdom
Introduction: The Multi disciplinary team (MDT) meeting is a well established process which determines patient management in an integrated fashion by healthcare professionals. The final outcome of the MDT is determined by a complex decision-making process which renders it an ideal platform for machine learning (ML) technologies. At present there are nearly 300 patients awaiting bariatric surgery at the Homerton Hospital after being discussed at the MDT. There are hundreds more awaiting MDT. There is also a greater demand on NHS staff due to the current COVID pandemic. Patient on the pathway often need investigations or a specialist review. At present patients are manually selected based on waiting times and discussed at a weekly basis. This means that often patients are not fully worked up before the MDT and need re-discussion.
The first step in understanding the process from referral to the MDT meant simplifying the pathway into layers. This was mapped to help develop algorithms for the dashboard (Fig. 1).
Attended Automation: The dashboard will be based on an ‘attended automation model’ which allows staff to focus more on exceptional cases. The dashboard will operate on Cerner—and will allow for interoperability between platforms by flagging up patients needing further input and will reduce delays, bottle necks in the system and help identify key process indicators which correlate with quality of care. Having an automated system means the audit process is seamless with real time information processing.
Where can Machine Learning be used?
ML techniques can be used in the case management of bariatric surgery patients and the GP referral system. Most importantly it will allow patient prioritisation based on clinical grounds post COVID.
What are the advantages?
The dashboard will identify when patients meet the criteria for MDT automatically. There will be a clear visual analogue to view where patients are on the pathway and trigger the need for early specialist referral (Fig. 2). This will lead to a more efficient service and prevent loss to follow-up.
Conclusion: Development of the dashboard has support of both our IT and Innovations lead. Not only can it be used in General Surgery it can be rolled out to other specialities based on our template.

Amazing technologies
P272—System to ensure continuous and clarity vision during the operating procedure without affecting or acting externally to the rigid endoscope
Andrés Granero
NORUCO, Spain
Minimally invasive surgery (MIS), uses rigid endoscopes to provide visuals of the operating field. Continuous vision is especially important during laparoscopy for precision of work performed and to avoid accidental injury of surrounding tissue and organs.
However, the condensation of water vapor and the fume from the cauterization fog the lens, as well as blood and tissue adhere to the lens, obstructs the view during the surgery.
Visual impairment increases the risk of error during surgery, patient injury, and the time required for the operation.
To solve that problems, available methods include the use of a hot water bath to warm up the laparoscope before and during the surgery, use of antifogging solutions, alcohol and surfactants, or external accessories. Sterile gauze is used to wipe the lens even against the tissue in the operating field. All of those methods acts from the outside of the endoscope and once it´s dirty or fog.
Noruco has developed the EHS, a revolutionary rigid endoscope that does not fog up and solve the problems of lens condensation and fogging during surgical procedures.
This unique and innovative solution, allows the same clinical process, since externally is like a traditional rigid endoscope but with the aforementioned benefits.
Our systems has been developed to be implemented in the manufacturing process of any type of rigid endoscope, changing the paradigm of MIS surgery by having consistent quality of vision.
Also the next generation of EHS possibily the lens cleaning directly in the operating field.

Amazing technologies
P273—Revolutionary rigid endoscope with no visuals interrupts during the operating procedure
Andres Granero
NORUCO, Spain
Minimally invasive surgery (MIS), uses rigid endoscopes to provide visuals of the operating field. Continuous vision is especially important during laparoscopy for precision of work performed and to avoid accidental injury of surrounding tissue and organs.
However, the condensation of water vapor and the fume from the cauterization fog the lens, as well as blood and tissue adhere to the lens, obstructs the view during the surgery.
Visual impairment increases the risk of error during surgery, patient injury, and the time required for the operation.
The current available methods include the use of a hot water bath to warm up the laparoscope before and during the surgery, use of antifogging solutions, alcohol and surfactants, or external accessories. Sterile gauze is used to wipe the lens even against the tissue in the operating field. All of those methods acts from the outside of the endoscope and once it´s dirty or fog.
Noruco has developed the EHS, a revolutionary rigid endoscope that does not fog up.
This unique and innovative solution, allows the same clinical process, since externally is like a traditional rigid endoscope but with the aforementioned benefits.
Our systems has been developed to be implemented in the manufacturing process of any type of rigid endoscope, changing the paradigm of MIS surgery by having consistent quality of vision.
Benefits:
Shorter surgery as there are not interrupts during the procedure.
Reduce the risk of contamination, likelihood of infection, and possible complications during the operation, endoscope is always in the operating field.
Reduce patient exposure time to anesthesia, the procedure time is shorter.
Increases control of the situation during the surgery, the rigid endoscope is 100% of the time in the field.
Greater efficiency results in better planning of he operating rooms and costs.

Amazing technologies
P274—Preoperative identification of gangrenous cholecystitis using a machine learning algorithm. A retrospective study
Alessandro Ussia1, S. Vaccari2, M. Minghetti3, A. Lauro2, I. R. Marino5, V. D'Andrea2, G. Palazzini2, G. Casella2, M. Cervellera4, V. Tonini3
1Ospedale del Delta, General Surgery, 2La Sapienza University, Umberto I Hospital, Rome, Department of Surgical Science, 3Sant'Orsola University Hospital, Bologna, Emergency Surgery Department, 4Ospedale Santissima Annunziata, Taranto, Department of General Surgery, Italy. 5Thomas Jefferson University—Philadelphia PA, Sidney Kimmel Medical College, USA
Background: Gangrenous cholecystitis (GC) is a life-threatening disease that requires prompt treatment and is associated with an increased risk of postoperative morbidity and mortality. There have been many attempts to identify it preoperatively, using a combination of clinical and laboratory findings and imaging studies, with multiple scoring systems being proposed, but it is not always possible to do so reliably.
Methods: We conducted a retrospective study involving 1640 patients with AC that underwent cholecystectomy in two Italian academic centres. We collected preoperative clinical findings, including symptoms, laboratory data and ultrasound imaging when available. We paired this data with pathology findings. We implemented a neural network model using the Tensorflow.Keras package and trained on 964 randomly selected cases. The model was then tested on the remaining cases to check for accuracy.
Results: Patients included in the study were predominantly female (57%), with an average age of 56,8 years and more than 66% of them had at least one comorbidity. 74 (4.5%) of specimens were found to have GC at pathological examination. The final model was run multiple times, with similar end results, and we selected that showed the best accuracy among them. It provided a Sensitivity and ROC AUC of 96%, but 63% specificity,
Conclusions: GC can be challenging to diagnose promptly. An automated algorithm could assist the surgeon and flag likely cases for review. Our algorithm compared favourably with others published in the literature, and could conceivably be integrated in A&E EMRs. However, it needs validation, possibly in a multicentric, prospective study to assess real-world performance and exclude overfitting.
Amazing technologies
P275—Endoluminal radiofrequency ablation of the main pancreatic duct is a secure and effective method to achieve stump closure
Fernando Burdio1, A. Andaluz2, E. Berjano3, B. Ielpo1, P. Sanchez-Velazquez1
1Hospital Del Mar, Surgery, 2Facultad De Veterinaria, Surgery, 3Universidad Politecnica De Valencia, Biomedical Engineering, Spain
Radiofrequency energy has been used both experimentally and clinically to manage the pancreatic remnant after distal pancreatectomies. Our goal was to determine whether endoluminal radiofrequency (RF) ablation of the main pancreatic duct in large animals would be more efficient than glue occlusion as an exocrine pancreatic atrophy-inducing procedure. Thirty-four Landrace pigs were assigned to either the transpapilar (n = 16) or transection (n = 18) groups. The transection implied the pancreas neck was severed. In each of these groups the remaining distal pancreatic duct was occluded either by RF or by glue. In the transpapilar group complete atrophy was observed in all the RF cases, while atrophy was incomplete in all the members of the glue subgroup. The failure rate of the main pancreatic duct (usually expressed by a pseudocyst) in the transection groups was dramatically higher in the glue subgroup than the RF subgroups (9 out of 9 and 1 out of 9, respectively) and postoperative mortality occurred only in the glue subgroup (3 out of 9). These results show the superiority of endoluminal RF ablation over glue for main pancreatic duct occlusion, as seen by the degree of atrophy and fewer postoperative pancreatic fistulas.

Amazing technologies
P277—Virtual Reality can be a Part of The Surgical Journey from The Preoperative Period until Home Recovery: A Concept to be Applied in The Future
Ahmed Gendia1, H. Rottenburg1, A. Tam2, A. Cota2, J Clark2
The Royal Cornwall Hospital, 1General Surgery Research and Development Department, 2General Surgery Department, United Kingdom
Introduction: Virtual reality (VR) is an emerging new technology in healthcare services with established benefits in both education and clinical services. It provides a powerful tool by producing a simulated interactive environment which enhances the patient’s experience and satisfaction in various settings. For example, mental health and obesity management and in the promotion of physical and cognitive rehabilitation.
Aim: To provide an insight into some of the established VR applications in surgical patient’s care and to provide a concept on virtual reality surgical care bundle (VRSCB) for patients undergoing surgery which can be applied throughout the journey from preoperative preparation until home recovery.
Methods: A non-systematic literature review on PubMed and Embase was done to identify across which fields VR technology has been trialled in relation to surgery. The search terms “Virtual Reality” and “Surgery” were used. On reviewing applications of VR in surgery, we identified four main areas of interest: preoperative education, perioperative support, postoperative pain management and rehabilitation.
Results: VR technology showed promising results in multiple setting that can be directed towards the patient’s journey from preoperatively till home recovery. VR was reported as a useful educational tool for vascular patients and patients undergoing radiotherapy for different disease mainly due to its powerful simulated three-dimensional environment. Reports also showed possible benefits of VR as a distraction tool for pain and anxiety related to orthopaedics, cardiothoracic, and minimally invasive surgery. Moreover, VR physical rehabilitation showed a strong outlet of the technology due to its engaging properties.
Conclusion: VR applications have shown applicable benefits in different stages of patient’s care undergoing surgery. However, these benefits have been limited and in early development. Additionally, VR applications can be tailored toward a care package in which patients can utilize the technology from the preoperative state, admission period until postoperative hospital and home recovery. Future studies and validations of VR applications should be carried to apply the technology throughout the entire patient pathway as virtual reality surgical care bundle (VRSB).
Amazing technologies
P278—Cloud-based AI-driven Video Analytics in Minimally Invasive Surgery: A Road to Data Driven Surgery
Ahmed Gendia1, A. Cota2, J. Clark2
The Royal Cornwall Hospital, 1General Surgery Research and Development Department, General Surgery Department, United Kingdom
Introduction: Surgical video recording plays an essential role in modern-day practice. It provides multiple uses including media for training, continued performance assessment and quality improvement. With the advances in surgical technology, recording videos has evolved to automated platforms using video-based assessments and cloud connectivity. These platforms make recording and viewing surgery much more applicable and useful through a secured limitless storage of clouding. This also have the advantage of their integrated artificial intelligence applications.
Aim: To provide an overview of some of these applications and how they can improve minimally invasive surgery in the future.
Methods and Results: Theator Inc., Touch Surgery™, C-SATS® are among platforms which provides cloud-based video storage and AI driven analytics. These platforms are also integrated with powerful AI and computer vision which help in annotating and segmenting of videos, analysing surgical steps, highlighting critical structures as well as providing a medium of communication through sharing and guidance.
Conclusion: Cloud based AI-driven video analytics is a new method of storing, analysing, and reviewing surgery videos. They also provide surgeons with a powerful AI integrated services that can help in viewing and critiquing videos in an easy and organized fashion. This helps to improve training, performance, and standardizing procedures. Also, this is closer step into an AI and data-driven surgical practice which have the potentials to improve outcomes.
Amazing technologies
P280—Endoluminal thermal ablation of main pancreatic duct for patients at high risk of postoperative pancreatic fistula after pancreaticoduodenectomy
Benedetto Ielpo, F. Burdio, E. Pueyo, P. Sanchez, E. Berjano, A. Radosevic, A. Andaluz, L. Grande
Mar University Hospital, General Surgery, HPB unit, Spain
Purpose: Multiple attempts have been made to manage the pancreatic stump and the pancreatic duct in order to reduce the rate of postoperative pancreatic fistula (POPF) after pancreaticoduodenectomy (PD), however radiofrequency-based technologies could help to achieve this goal. Previous encouraging clinical and experimental results support the use of endoluminal thermal ablation (ETHA) of the main pancreatic duct to reduce pancreatic exocrine secretion and hence POPF. We here describe our early clinical experience with ETHA of the main pancreatic duct in patients at high risk of POPF.
Methods: 11 cases underwent PD for malignancy with a high risk of POPF (adenocarcinoma, obese patients, surgical difficulties with heavy intraoperative blood loss, soft pancreas or walled-off pancreatitis and a tight small pancreatic main duct). In both cases, ETHA of the main pancreatic duct was conducted intraoperatively just before Blumgart-type pancreatic-jejunal anastomosis using a ClosureFast catheter (Medtronic, Mansfield, MA, USA) normally used for varicose vein treatment (therefore an off-label use).
Results: Although a clear radiological POPF was detected in 4, the clinical postoperative course in all cases was uneventful. Little pancreatic fluid collected in the abdominal drainage with low levels of amylase enzyme, confirming low exocrine pancreatic function. No other procedure-related complications were detected.
Conclusion: Endoluminal thermal ablation of the main pancreatic duct may be a feasible and safe technique to reduce the adverse effects of POPF after PD.
Amazing technologies
P282—New transilumination rectoscope, used with enhaced ICG light, in MI rectal cancer surgery
Mario Alvarez-Gallego, I. Pascual-Miguelañez, S. Gortazar-De las Casas, N. Gonzalez-Alcolea, C. Gonzalez-Gómez, F. Tone, J.A. Gazo-Martinez, I. Prieto-Nieto, J.L. Marijuan-Martin
Hospital Universitario La Paz, Surgery, Spain
New Rectoscope for Minimally Invasive Rectal Cancer Surgery Rectoscope that by means of transillumination and by incorporating a radial mobile light source, allows the surgeon to decide with better accuracy the distal resection margin in MIS rectal cancer surgery. When used in MIS with ICG mode, white light is much more visible, improving the accuracy of this device.
Unmet need: The transection of the distal rectum in MIS (minimally invasive surgery) rectal cancer surgery is challenging. We must ensure a clear, but close distal margin, which is oncologically safe and spares healthy rectum from being removed.
After neoadjuvant therapy, there might be an important clinical and pathological regression in the rectal tumor. This can make it difficult for the surgeon to identify the distal aspect of the rectal tumor. In MIS we lack the great majority of the tactile information we have in traditional surgery, making it even more difficult to decide the rectal transection site in rectal cancer surgery. This is why we developed this device, to assist the surgeon in deciding a clear but close distal resection margin in rectal cancer MIS surgery.
Description and essential characteristics: Traditional rectoscopes have a light source that is parallel to the long axis of the rectoscope. In the case of our new device, the light source is placed perpendicular (radial) to the longest axis of the rectoscope, which is made of a translucent material, and therefore this light source is visible in the rectal surface through transillumination. This light source is mobile along the longest axis of the rectoscope, in a channel separated from the main stem of the rectoscope. This permits the light source to be moved withouth losing the pneumorectum needed to visualize inside the rectum This mechanism enables the assistant to place, under direct visualization, the light source at a given distance from the tumor. This distance will be the distal resection margin decided by the surgeon. The transillumination of the rectum by this mobile light source will enable the surgeon to perform the transection at this chosen point, therefore allowing a precise distal margin, tailored to each patient.
When used in ICG mode, white light is much more visible than in normal mode, improving the visualization of the rectal transection site, decided by the surgeon.
Competitive advantages: The main advantages of the rectoscope are as follows: • Allows the surgeon to optimize the visualization of the rectum and precisely determine the point where the resection of the rectum should be transeccted, if necessary. This increased accuracy allows, in turn, a safe reduction of the distal resection margin. Thus shorter length of rectum is removed possibly allowing better defecatory patient functionality and less risk of dehiscence. At the same time, this will facilitate a total elimination of tumor tissue, minimizing the risk of tumoral transection and, therefore, tumor persistence or recurrence. Current stage of development A first prototype was developed by the research team (Hospital La Paz surgeons and UpDevices and MaqLAB (Carlos III Univerisity) engineers). The first prototype was tested in porcine model and iterated. The definitive prototype was manufactured by 3D printing, and we have started a clinical trial assessing safety and feasibility started May 2020, and is about to be completed (NCT04899726) at La Paz University Hospital, Madrid, Spain. State of intellectual property: Spanish patent P201630551, granted in August 2018. International patent application PCT/ES2017/070249. Figures 1: Prototype of the rectoscope with a mobile light source in the longest axis of the rectoscope Fig. 2. Rectum as seen in MIS with the visible light transilluminating from the rectoscope, in ICG mode. This is will be the transection point given the distal resection margin decided by the surgeon.

Amazing technologies
P284—Laparoscopic right hemicolectomy with intracorporeal anastomosis using handxtm hook and needle holder
Monica Ortenzi, A Szold
Assuta Medical Center, Israel
Background: HandXTM is a handheld, powered laparoscopic device with interchanging single-patient fully articulating instruments, that was recently introduced to the market. The HandXTM consists in a modular platform that could be used by the operating surgeon beside the patient’s bed. It is electromechanically controlled, and, as the manual interface is handled by the surgeon, the movements of the surgeon’s fingers are translated to the instrument-articulating tip. In times of an increasing awareness for healthcare system costs, it offers the possibility to improve surgeon’s dexterity, precision and ergonomics in a more cost-effective manner than other platforms. Previously it has been used either for tissue manipulation or suturing. This report is to show the feasibility and safety of this technology implemented with a monopolar dissecting hook in a complex abdominal procedure.
Methods: We report one of the first experience of a major abdominal surgical procedure performed with the aid of the HandXTM articulating monopolar hook and needle holder (a video is available).
Results: The index case was a 37-year-old female with right colon cancer. Three 5 mm trocars 1 umbelical, 1 in the right iliac fossa and 1 right pararectal were used. An additional 12 mm epigastric trocar was placed in the left midclavicular line to allow the insertion of the stapler. A medial to lateral approach was used. Dissection was carried out with the HandXTM monopolar hook was used for monopolar precise dissection was required as in vessels and lymph nodes isolation, in the dissection of the omental attachments to the colon and mobilization of the right colon along the Toldt’s fascia. Other sources of energy were resorted when a monopolar dissection was not considered safely enough as in the division of major vessels or in the dissection of highly vascularized tissue. A side-to-side mechanical intracorporeal anastomosis was performed and the HandXTM monopolar hook was used to perform the enterotomies for the laparoscopic stapler. The articulating needle holder was used to close the remaining defect with a running absorbable two layered suture. The specimen was removed with a Pfannestiel incision. The operative time was 124 min, no blood loss nor intraoperative complications were observed the patient was discharged after 4 days after the operation.
Conclusions: This report showed the feasibility and safety of the new HandXTM platform applied to a major abdominal procedure. The hook HandXTM technology can be safely adopted to obtain fine dissection and combines the higher maneuverability and dexterity that this kind of technology can offer, when compared with the traditional stiff laparoscopic instruments, with the possibility to use an energy device for tissue dissection.
Amazing technologies
P285—How to deal with multiple images’ fusion for simulation phantoms’ development: example of a 3D printed platform for living-donor kidney procurement
Erika Negrello1, V. Mauri1, S. Marconi1, V. Gallo2, O. Caserini, 2 L. Pugliese2, A. Peri2, F. Auricchio1, A. Pietrabissa1, 2
University of Pavia, 1Civil Engineering and Architecture, 2Fondazione IRCCS Policlinico San Matteo, General Surgery 2, Italy
To date, commercial surgical simulation phantoms are usually made of standard and average components, often failing to grasp the real anatomical complexity and variability among different human subjects. The present study focuses on the production of a realistic simulation platform for a living-donor kidney procurement. An approach to combine multiple medical images—namely Computed Tomography (CT) and Magnetic Resonance (MRI)—of real patients has been defined in order to virtually reconstruct all the anatomical structures of interest. 3D printing technology—which allows to reproduce objects with highly complex geometries and different mechanical properties—can then be exploited for the physical replica of the virtual patient-specific anatomy.
The workflow starts from an accurate definition of all the anatomical structures to be included in the phantom. For each identified anatomical district, a dataset of medical images suitable for the virtual reconstruction is then selected. Since in the clinical practice diagnostic images are acquired for pathological cases, finding a dataset where the organ of interest is both healthy and well contrasted is not trivial.
Consequently, virtual models of the selected anatomical structures are usually segmented on different datasets and then registered and dimensionally rescaled according to average anthropometric measurements. The ultimate goal is to obtain a complete and consistent virtual reconstruction of the region of interest starting from real anatomies.
In the present study, one MRI dataset and three CT scans of different phases and patients (CT1, CT2 and CT3) have been used. The upper vascular tract (both arteries and veins) and kidneys are segmented on CT1—arterial phase, bones and skin on CT1—portal phase, while bladder and ureters on CT1 – delayed phase. Lower arterial and venous segments are reconstructed on CT2 – arterial phase and CT3 – arterial phase respectively. Finally, psoas and iliac muscles are segmented on the selected MRI [see Fig. 1]. Not visible anatomical structures (i.e. peritoneum), supports and assembling facilities are CAD designed.
After reconstructing, scaling and registering all the relevant anatomical structures, the resulting 3D virtual model of the pelvic area was subjected to clinicians’ evaluation. The model was rated by the clinicians as a good representation of the anatomical district of interest and of the intra-operative reality of living-donor kidney procurement. All the structures have been manufactured with the most suitable 3D printing technology and assembled into the final simulation platform [see Fig. 2].

Amazing technologies
P286—Feasibility and safety of Hyperthermic pressurized intraperitoneal aerosol chemotherapy (HPIPAC) using a new nozzle system in large animal model
Sa-Hong Min1, H.H. Kim2
1Chungnam National University Sejong Hospital, Surgery, 2Seoul National University Bundang Hospital, Surgery, Korea
Background: After developing the technology for HPIPAC, there were limitations with the existing nozzle system (CapnopenTM). We have developed a new nozzle system which doesn’t need an angio-injector but a simple pump to pump CO2 into the nozzle which makes the aerosol particles much finer. The aim of this study was to do an in-vivo large animal model to prove its feasibility and safety of the system.
Method: Three 20 kg female pigs were used for in-vivo experiment. Animal experiment was approved by the IACUC. Under general anesthesia, three trocars were placed on the center(umbilicus), right middle quadrant and left middle quadrant of the abdomen. Two separate temperature probes were inserted; one to the rectum for core temperature and one into the abdomen with a small incision to detect the intraabdominal ambient temperature. HPIPAC circuit is applied in the trocars (input, output, and nozzle). After heating up the intraabdominal temperature to 40–42 °C 100 cc of 5% dextrose (to mimic chemotherapy) was injected using the new nozzle system. After aerosolization, heat circulation was continued for one hour. The three pigs were all kept alive for 7 days and autopsy was done. At autopsy, tissue biopsy of each organ with a visceral peritoneum was done to check for burn.
Results: After initiating HPIPAC system heat circulation, Intraabdominal temperature reached 40–42 °C in 50–60 min. After injecting 100 cc of 5% dextrose with the new injector, circulation was re-started and maintained for one hour. Core temperature did not exceed over 38.3 °C During the 7 days, all the pigs were healthy, well fed with high appetite and no fever. After autopsy, most tissues showed inflammation such as panniculitis and fibrosis of subcutaneous tissue, without any significant tissue damage due to heat.
Conclusion: HPIPAC is feasible and safe in large animal model. Our system still needs some modifications for human use. After modification and medical device certification, further studies should be done for safe human use.
Amazing technologies
P287—Learning curve in experimental microsurgical anastomosis training using state-of-the-art wearables
José Castillo Rabazo1, Juan A. Sánchez-Margallo1, E.A.R. Abellán Rubio1, L.C. Pires Louça1, M.J. Jara Muriel1, J.M. Lasso Vazquez2, F.M. Sánchez-Margallo3
1Jesus Uson Minimally Invasive Surgery Centre, Microsurgery, 2Gregorio Marañón Hospital, Plastic surgery, 3Jesus Uson Minimally Invasive Surgery Centre, Scientific Direction, Spain
Introduction: This study aims to assess the impact of experimental microsurgical anastomosis training on the microsurgeon's workload and surgical performance.
Material and methods: Surgeons with different experience in microsurgery participated in this study. They were asked to perform eleven anastomoses on simulator with 8/0 suture and 6.4 mm needle, with a maximum time of 10 min per anastomosis. Anastomoses were performed following the vascular technique of triangulation and a total of 8 knots. All repetitions were performed on the same day. A state-of-the-art wireless surface electromyography (sEMG) system (Delsys Trigno™) was used to record and analyze the muscle activity of each participant. Eight sEMG were attached (bilaterally) to the paravertebral, upper trapezius, lower lumbar, and supinator longus muscles with the purpose of acquiring muscle activity. Data was recorded at the first (R1), sixth (R6) and eleventh (R11) repetition so they could have four anastomoses between recordings for practice. Surgeons had a 15-min break before the sixth and the eleventh procedure to avoid fatigue. Surgical procedures were also videorecorded for later rating using the Stanford Microsurgery and Resident Training (SMaRT) scale, a tool for objective evaluation of microsurgical performance. Number of knots made for the 11 anastomoses were also evaluated as well as the execution time. Finally, percentage of the maximum voluntary contraction (% MVC) was also calculated from sEMG data to assess muscular effort for each participant.
Results: Three right-handed novice surgeons and one expert surgeon participated in this study with a total of 44 anastomoses performed. None of the novice surgeons completed the anastomoses in time. Two novice surgeons improved the number of knots given by two and one of them by three between R1 and R11. The expert surgeon completed R1 in 10 min and was able to complete R11 in 7 min and 15 s. Surgical performance given by the SMaRT scale increased by 11.6 ± 2.05 on average between R1 and R11 for novice surgeons. The expert surgeon had the maximum score in every case. % MVC was higher for the three novice surgeons compared with the expert in every muscle group, except for the left supinator longus and the left upper trapezius. Novel surgeons had on average higher % MVC on the muscles on the right side.
Discussion and Conclusion: Training was effective not only for novice surgeons but also for the expert, as denoted by the increase in the SMaRT score and the number of knots given in the case of the novice surgeons and in the reduction on the time employed in the task in the case of the expert. Novel surgeons had a higher level of % MVC on their dominant side for the supinator longus and the upper trapezius as compared to the expert surgeon, which could be an indicator of inadequate posture and a lower bimanual dexterity. Expert surgeon’s % MVC values were more constant between the right and left size, which implies a better bimanual dexterity and a better posture.

Amazing technologies
P288—Novel ex-vivo database of a murine model of colorectal cancer using optical coherence tomography
Jorge Bote1, Francisco Sánchez Margallo1, J.F. Ortega-Morán2, C. López-Saratxaga3, B. Pagador2, A. Picón3, E. Terradillos3, B. Moreno-Lobato1, F.M. Sánchez-Margallo4
Jesús Usón Minimally Invasive Surgery Centre (CCMIJU), 1Animal Modellings, 2Bioengineering, 4Scientific Director, Cáceres, 3Tecnalia, Derio, Spain
Introduction: Optical Coherence Tomography (OCT) provides structural information and has the ability to diagnose colon polyps and can be improved by machine learning algorithms. OCT image databases are needed to facilitate the development of OCT algorithms.
Material and methods: We acquired a database of colon samples from Pirc rats, using a Thorlabs OCT with a central wavelength of 930 nm providing an A-scan rate of 1.2 kHz, an axial resolution of 7 μm in air, a lateral resolution of 4 μm, a FOV of 6 mm x 6 mm, an image depth of 1.7 mm in air and a sensitivity of 107 dB. For OCT analysis we used colon samples previously fixed in formaldehyde from healthy, hyperplastic and neoplastic tissue and preserved in PBS and a concentration of 0.1% sodium azide at 4 ºC. For this purpose, once each animal was anaesthetised and after an exploratory colonoscopy, a laparotomy was performed through the linea alba and a subsequent colotomy along the entire colon for the correct evaluation of the different lesions found in the colon. The colon was then removed from the animals and a sample preservation protocol was used for subsequent ex-vivo measurements.
Results: This database consists of 3D OCT volumes (C-scans) and 2D images (B-scans) of murine samples of: 1) healthy tissue (18 samples; 66 C-scans; 17,478 B-scans); 2) hyperplastic polyps, obtained from a murine model of induced colorectal hyperplasia (47 samples; 153 C-scans; 42. 450 B-scans); 3) neoplastic polyps (adenomatous and adenocarcinomatous), obtained from a clinically validated Pirc F344/NTac-Apcam1137 model (232 samples; 564 C-scans; 158,557 B-scans); and 4) unknown tissue (adjacent to the polyp, presumably healthy) (98 samples; 157 C-scans; 42,070 B-scans).
Conclutions: A new and extensive ex-vivo OCT database of murine models of colorectal cancer has been obtained and openly published for the research community. It is a very useful tool for the training, testing and validation of machine learning algorithms for classification/segmentation, for the study of the correlation between OCT results and histopathological structures, and for the development of new non-invasive methods for in situ diagnosis of colorectal cancer.
Amazing technologies
P289—Clinical validation framework for polyp detection methods based on deep learning
Luisa F. Sánchez-Peralta, 1Francisco M. Sánchez-Margallo, B. Glover4, C.L. Saratxaga3, J.F. Ortega-Morán1, S. Nazarian4, A. Picón, 3 J.B. Pagador1
Jesús Usón Minimally Invasive Surgery Centre, 1Bioengineering and Health Technologies Unite, 2Animal Modellings, 3Tecnalia, Spain. 4Imperial College London, United Kingdom
Introduction: Deep learning (DL) has arisen with great success in recent years with promising applications in the field of medical imaging. In particular, there is increased interest on the published methods for polyp detection, localization and segmentation based on DL approaches. However, there is no clinical validation framework that allows for their fair comparison. Each work uses its own images and metrics, which hinders a straight-forward comparison of results.
Method and methods: In this work, the PICCOLO white-light (WL) and narrow-band imaging (NBI) colonoscopy dataset has been selected as it is the largest, manually annotated, publicly available dataset. The dataset gathered from 40 patients includes 3,433 images from 76 lesions, and is split into training, validation and test sets. Images were selected from the original videos, in the test set category, containing one or more polyps, or no polyps. Both WL and NBI images were selected. In addition, a set of metrics were identified to aid reporting.
Results: In total, 65 images were selected to be included in the clinical validation framework. Two thirds of them contained at least one polyp (19 polyp images vs 46 non-polyp images) and they were mostly WL images (54 WL images vs 11 NBI images), since NBI is not used for detection but rather for diagnosis. Metrics based on the confusion matrix were also provided, so that all authors are able to report results on the same images and on the same terms.
Conclusions: This clinical validation framework can be used to standardize methods for polyp detection, not only based on DL but on any technology. It can also be used to distinguish between endoscopists and DL methods. Firstly, the framework allows the developer to choose the model which provides the most optimal results. And secondly, there is the added benefit of the model over clinical expertise. Further work is needed to improve the presented validation framework with colonoscopy videos.
Amazing technologies
P290—From qualitative to quantitative mechanical assessment of 3D printing materials for suture training
Valeria Mauri1, M. Golosio1, E. Negrello1, G. Alaimo1, A. Peri2, L. Pugliese2, F. Auricchio1, A. Pietrabissa3, S. Marconi1
1University of Pavia, Civil Engineering and Architecture, 2Fondazione IRCCS Policlinico San Matteo, General Surgery II, 3Fondazione IRCCS Policlinico San Matteo/University of Pavia, General Surgery II, Italy
3D printing (3DP) technology allows the manufacturing of extremely complex geometries, thus perfectly suitable for producing realistic replica of patient-specific anatomies. While morphological aspects can be easily handled, the reproduction of tissues mechanical properties poses major problems: to date, available 3DP materials are still quite limited in mimicking biomechanical properties of soft tissues, thus limiting the possibility of using 3D printed models for simulation purposes.
In this context, photopolymers are the most promising class of 3DP materials: through Material Jetting technology it is possible to mix photopolymers, allowing a fine tuning of the final object’s mechanical properties. In the literature, mechanical properties of 3DP materials are only assessed through qualitative studies, based on the subjective feedback of surgeons. The main goal of the present study is to develop a methodology for a quantitative evaluation of 3DP materials, defining specific mechanical tests to assess their performance for suture training.
An expert surgeon was initially enrolled to identify the main parameters of interest: samples made of different photopolymer combinations were produced through a J750 Digital Anatomy 3D printer (Stratasys®). For each material, the surgeon performed a suture with a Prolene 5.0 surgical thread. The identified parameters were: (i) puncture force, (ii) resistance to the stitch, (iii) thread sliding, (iv) surgical knots tightening and (v) juxtaposition of the segments.
From the mechanical point of view, parameters (i) and (ii) were considered the most relevant. For the puncture force, cylindrical samples with various thicknesses and material combinations were produced and tested through an ad hoc experimental set-up designed to measure puncture force through a surgical needle [See Fig. 2]. All mechanical tests were performed through a MTS Insight Testing System®. The same mechanical tests were performed also on porcine aorta samples, to be used as a biological comparison.
For the materials’ resistance to stitch evaluation, the samples sutured by the surgeon were subject to uniaxial traction tests [See Fig. 1]. Moreover, single suture traction tests were performed to have more repeatable and reliable results.
Puncture test results clearly show the possibility to achieve a performance comparable to a target biological tissue acting on the thickness of the sample (e.g. 3D printed Agilus30 samples 0.5 mm thick matches aortic arch values). Manufacturing constraints should be taken into account: a thickness lower than 0.7 mm would be difficult to treat with the necessary post-processing without damaging the structure. On the other hand, stitch traction tests highlight important limits due to the absence of a fibrous reinforcement structure – proper of biological vascular tissue – and to the sample layers’ stratification.

Amazing technologies
P291—Versatile 3D-printed pelvi-trainer for training in laparoscopic rectal procedures – concept and development
Radu Claudiu Elisei1,2, F. Graur2, C. Popa2, S.V. Moldovan1, E. Mois2, D. Pisla3, C. Vaida3, A. Cote1, N. Al Hajjar2
1Emergency County Hospital, Bistrita, 2University of Medicine and Pharmacy “Iuliu Hatieganu”, General Surgery, 3Technical University, Robotics Department, Cluj-Napoca, Romania
Introduction and background: Minimally invasive pelvic surgery of the rectum (pelvic laparoscopic surgery) is in many centers the gold standard for these procedures and is an advanced level laparoscopic surgery that requires the acquisition of specific skills and a longer training period that is also much more expensive.
One solution in this regard would be to optimize training programs to make them more accessible and less expensive, especially for acquiring basic skills in pelvic laparoscopic surgery. And this according to the goal of establishing a training as unitary as possible for surgeons in the EU as well as worldwide.
Material and methods: Based on the CT images of a female pelvis from the anatomy museum, we reconstructed this pelvis in 3D and with the help of a 3D modeling software we selected the inner surface of the pelvis, the surface of interest, and we made a virtual pelvitrainer. This pelvitrainer was 3D printed using FDM (fused deposition modeling) technology and placed in a transparent plastic storage box on the lid of which we made valves for the trocars and the laparoscope and mounted a webcam. Thus, it can be used with laparoscopy equipment as well as at home using a webcam and a laptop. Inside the pelvis we adapted several exercises to acquire the most important skills in pelvic laparoscopic surgery.
Results: We made this versatile 3D printed pelvitrainer, at a production cost not exceeding 300 euros, which can be used both with complete equipment for laparoscopic surgery and with a webcam and a laptop at home to acquire the most important skills in pelvic laparoscopic surgery: perfect coordination, precise movements, the ability to dissect and suture in the narrow pelvic cavity.
Thus, we conceived a 3-step training program:
The first step: we adapted 4 exercises in the pelvic excavation in this sense: coordination, precise movements, cutting following a pre-established route and suturing using pre-established landmarks.
The second step is dissection, clip closure of the vessels, resection and suturing of a pig intestine.
The third step is the dissection and resection with TME of a pig rectum with anastomosis.
Also, this pelvitrainer can be used with a rectum 3D printed mold made of silicone. Silicone material reproductions of the rectum, ureters, pelvic vessels are easily obtainable at low costs.
Conclusions: This concept of versatile 3D printed pelvitrainer and training program can bring a significant improvement to the learning curve, the standardization of training in minimally invasive rectal surgery and to the development of laparoscopic surgery without risk for the patients.
Key words: training, pelvitrainer, rectal laparoscopy, 3D printing.

Amazing technologies
P292—Breast gelatin based experimental model for ultrasound guided procedures – concept and development
Radu Claudiu Elisei1, 2, C. Tiu3, S.V. Moldovan1, F. Graur2, C. Popa2, E. Mois2, A. Cote4, N. Al Hajjar2
1Emergency County Hospital, Bistrita, 2University of Medicine and Pharmacy “Iuliu Hatieganu”, General Surgery, Cluj-Napoca, 3Municipal Hospital, General Surgery, Campina, 4Emergency County Hospital, General Surgery, Oradea, Romania
Introduction and background: In mammary gland surgery, ultrasound, elastography and ultrasound-guided punction of tumors or sero-hematic or purulent collections are common practice. However, there are not many options when it comes to specific training programs in this regard. Thus, the development of such a training program in morphological and interventional ultrasonography of the mammary gland is a necessity.
Materials and methods: By using a gelatin solution, we created a reproducible, inexpensive and multi-purpose experimental model. We used a mold that mimicked the shape of a medium-sized mammary gland in which we poured a gelatin solution with ultrasonographic contrast for breast tissue, vegetable fiber to mimic the hyperechoic connective tracts in the mammary gland, and tumor formations were mimicked using gelatin solution as well, but without any without ultrasonographic contrast elements, being well known that the breast tumors are hypoechoic. Also, the intramammary collections were mimicked using liquid filled balloons in various colors and sizes. Different concentrations of gelatin per model were used, and flour, corn starch and talcum powder were used for contrast. all models have been tested ultrasonographically and elastographically.
Results: We designed 3 models with different concentrations of gelatin: low, intermediate and high. The mammary gland tissue was transformed into hyperechoic tissue using flour, corn starch and talcum powder, tumor formations of different sizes were created from gelatin without ultrasonographic contrast with higher concentrations of gelatin compared to the surrounding “glandular” tissue, and breast collections were created by using balloons of different sizes filled with coloured liquid. The model with the highest concentration of gelatin was the most reliable for performing ultrasound-guided punctions, and the intermediate model for performing elastography for glandular tissue and tumors.
Conclusion: The gelatin model of the mammary gland with tumors and intramammary fluid collections has proven to be a reliable model for training in diagnostic and therapeutic ultrasound of the mammary gland.
Key words: training, breast, experimental model, ultrasound-guided procedures.

Amazing technologies
P294—Objective assessment with force parameters in laparoscopic vs robotic suturing; a crossover validation study
Sem Hardon1, .E Willuth2, M. Rahimi1, F. Lang2, C. Haney2, E. Felinska2, K. Kowalewski2, B. Müller-Stich2, F. Daams1, F. Nickel2, T. Horeman3
1Amsterdam UMC, Surgery, 2Heidelberg University Hospital, Surgery, 3Delft University of Technology, Biomechanical Engineering, The Netherlands
Introduction: Increasing use of robotic surgery with limited evidence for the assessment of technical skills and technical competence is raising concern. The aim of this study was to provide validity evidence for objective force-based assessment of technical skills for laparoscopic and robotic surgery.
Methods: A multicenter crossover validation study was conducted. Trainees with distinctly different levels of laparoscopic experience were divided into three groups (novice, intermediate, expert) and enrolled in a standardized training curriculum. Each trainee performed six trials of a standardized suturing task using a laparoscopic box trainer and six trials using the DaVinci surgical robot. Both systems were equipped with the previously validated ForceSense system (Fig. 1) for metric based assessment of tissue handling skills. This system provided four force-based tissue handling metrics (maximum absolute force, mean non-zero force, max impulse and force volume) and time to complete task. Construct validity was assessed. Between group analysis was performed to show transfer effect between both modalities. Linear regression tests were used for in-depth learning curve analyses.
Results: A total of 720 trials, performed by 60 trainees, were analyzed. Construct validity was established for Time, max force and max impulse parameters (p ≤ 0,001). Significant improvement of the total task completion time and maximum impulse of both the laparoscopic and robotic trials was observed in all three groups with different levels of experience. In contrast to experts, novices and intermediates that switched from the laparoscopic suturing approach to the robotic suturing approach increased their applied maximum and mean interaction force (Fig. 2). When switching from the laparoscopic to the robotic approach the experts showed significant better completion time and maximum force metric outcome.
Conclusion: Force-based assessment in laparoscopic and robotic suturing training can be used to indicate tissue handling skills and technical competence at the end of training. Validity evidence was provided for future assessment of technical skill acquisition and risks for tissue trauma in a preclinical phase. Based on these results it is advised to incorporate objective assessment methods into surgical training curricula to determine technical competence before operating on real patients.

Amazing technologies
P297—New ultrabright fluorophore presenting enhanced intensity in the extrahepatic biliary tree
Andrea Picchetto1, G D'Ambrosio2, K. Peneva3, D. Botteri3, S Ségaud4, M. Barberio4, V. Agnus4, J Marescaux5, S. Gioux6, M. Diana4. 5
1Sapienza University of Rome, Policlinico Umberto I University Hospital,, Emergency-Acceptance, Critical Areas and Trauma Department, 2"Umberto I" University Hospital, "Sapienza" University of Rome, 1)Department of General Surgery and Surgical Specialties, Sapienza University of Rome, Italy.3Friedrich Schiller University Jena, Jena Center of Soft Matter, Institute of Organic Chemistry and Macromolecular Chemistry, Germany.4IHU-Strasbourg, Strasbourg, France, Institute of Image-Guided Surgery, 5IRCAD, Research Institute against Cancer of the Digestive System, Strasbourg, 6ICUBE Laboratory, Photonics Instrumentation for Health, Strasbourg, France
Background: Near-infrared Fluorescence Cholangiography (NIRF-C) allows an improved visualisation of the biliary tree anatomy, which could lower the risks of bile duct injuries during cholecystectomy. However, the most commonly used fluorophore substance, the Indocyanine Green (ICG), presents a high background fluorescence from the liver, reducing the signal-to-noise ratio (SNR) and disturbing the identification of the biliary structures.
Aim: To develop a new fluorophore presenting ICG-like optical properties and an increased fluorescence intensity after being excreted in the extrahepatic biliary system leading to a reduced SNR.
Project description: The hypothesis was that the chemical design of the new dye would increase the fluorescence emission (quantum yield) when dissolved in bile, thanks to its solubility in apolar environment. In the porcine model, this new ultrabright fluorophore was administered intravenously. During 60 min, a custom made Near-Infrared multispectral camera system was used to monitor the evolution of the fluorescence signal to the liver and to the extrahepatic biliary system. The fluorescence of the new dye was compared to that of an ICG-based reference card (Green Balance™; Diagnostic Green), using a proprietary software. Images were obtained in both White Light and NIR modalities at a fixed camera-to-target distance.
Preliminary results: Experimentally we could observe that after 15 min from the injection, the fluorescence intensity of the common bile duct was much higher when compared to the reference card, while the background liver signal was lower, with a very high SNR. This finding warrants further evaluation, since the properties of this new dye can have multiple applications in hepatobiliary surgery, including, but not limited to, the increased visualization of the biliary anatomy without background fluorescence from the liver (see Fig. 1).
Amazing technologies
P298—Same day administration of Indocyanine Green with use of SPY- Colour Segmented Fluorescence imaging to identify Colorectal Liver Metastases intra-operatively
Anastasia Benjafield, A Tanase, S Aroori
University Hospitals Plymouth, Hepatobiliary Surgery, United Kingdom
Background: Near-infrared fluorescent (NIRF) imaging using indocyanine green (ICG) has various applications in minimally invasive surgery. There are a number of techniques in timing and dose administration. Visually different fluorescent enhancement patterns correlate with different pathologies to aid identification of lesions intra-operatively. The aim of this study is to present our experience with utilisation of Colour Segmented Fluorescence (CSF) ICG mode in laparoscopic liver surgery for colorectal liver metastases (CRLM).
Methods: We present a single surgeon (SA) experience with the use of laparoscopic fluorescence guided imaging surgery (L-FGIS) at University Hospitals Plymouth, UK. Between November 2020 and July 20,201, L-FGIS was used in seven patients with suspected CRLM. ICG was administered intravenously at a dose of 0.2 to 0.3 mg/kg IV 2–3 h prior to liver surgery. Through use of the SPY-CSF imaging mode, the image is scaled as to NIRF fluorescence intensity to allow for the clear identification of the CRLM intra-operatively.
Results: A total of seven patients (Four males) with median age of 74.3 years (range: 30.5 -86) underwent L-FGIS during the study period. Two out of seven patients underwent re-do liver surgery. The median size of the tumour was 27 mm (range: 10-65 mm) and median number of tumours were one (range: 1–2). To visualise the tumour and to avoid the interference of green background liver, ICG camera was switched to CSF mode. All lesions had signet ring appearance under CSF mode (see Fig. 1) apart from one patient (necrotic lesion). The histology of resected specimens contained well to moderately differentiated colorectal adenocarcinoma metastasis. R0 resection was achieved in all patients and median clearance of the tumour was 3 mm (range 0.4-10 mm).
Conclusions: In our limited experience ICG administered at least 2–3 h prior to surgery can identify superficially located colorectal metastases, provided ICG camera is switched to CSF mode. Superficially located lesions are easily identifiable under CSF mode. CSF mode helped us to identify the lesions and to mark the resection margin. The use of ICG is an important advancement in CRLM liver surgery and further research is needed to optimise image interpretation and correlate with clinical resection outcomes.

Amazing technologies
P299—Implementation of an alternative pathway for colorectal cancer resections during the covid-19 pandemic
Joel Thomas, S. Kaul, A. Mansuri, N. Rajendran, S. Banerjee, J. Huang
Queens Hospital, General Surgery, United Kingdom
Aim: This report summarizes the experience of implementing an alternative pathway for colorectal cancer resections during the second wave of Covid-19 in the UK. It focuses on the cooperation between major NHS trusts in London to come together under one roof to reduce the backlog created by the pandemic.
Introduction: The coronavirus disease 2019 pandemic (Covid-19) caused by the SARS-CoV-2 coronavirus continues to challenge the healthcare system, staff and general public in a variety of ways. Although strict measures of social distancing and hand hygiene have helped diminish peak projections, hospitals continue to be overwhelmed. During the peaks, surgical theatres were converted to additional ICU’s and surgical health care providers were redeployed to provide ventilator support for patients affected with Covid-19 infection. NHS bed capacity was limited and therefore non-urgent surgical procedures were cancelled, owing to lack of capacity and concerns over patient safety (1). As Surgeons, we developed guidelines based on expert recommendations, to defer or postpone care for cancer patients as a protective/preventative measure (2). A study conducted by the scientists at the Institute of Cancer Research, London found that a delay of surgery by 3 months among 94,912 patients who would have had surgery if not for the delay due to the pandemic, would lead to an additional approximately 5000 deaths (3). This proves the fact that neither time nor cancer stops even at times of a pandemic, hence the challenge at present would be to find solutions for the backlog of Cancer resections that were piled up due to the Covid-19 pandemic. Here we highlight various measures taken by the Colorectal Surgery team at Queens Hospital, London to reduce this backlog during the second peak of Covid-19 pandemic in the UK.
Description: All elective cancer resections were temporarily stopped in our hospital at the time of the first wave. This led to a huge pile up of the cases and we were worried this would negatively affect the 5-year survival rate of our cancer patients. During the second wave we initiated a plan to carry out our elective cancer resections in the private sector due to shortage of beds in NHS hospitals. We collaborated with 3 other hospitals to pool in resources and started operating on a regular operative list at a private hospital in Central London. All the 4 hospitals collaboratively provided services to ensure 24 × 7 care for the patients by providing both manpower and equipment. Surgical registrars and house officers from all the partner hospitals were deployed onsite on rotation. Daily onsite ward rounds were conducted by various surgical consultants in addition to an offsite on-call consultant who monitored the patients remotely. This was the first time that the surgical teams from the various partner trusts worked collaboratively to ensure safe care for the cancer patients. Besides providing for manpower, infrastructure had to be bolstered. Surgical instruments, kits and laparoscopic stacks were loaned to the private hospital to ensure a smooth run of the service. Industry also supported our scheme with provision of loan kits and representative support to help theatre nurses acclimatize to surgical practices of the various participating hospitals.
Surgical training was seriously affected during the pandemic and this scheme also turned to be a sigh of relief for the surgical registrars. The new elective list of cases in the private sector was operated on by two surgical registrars’ everyday with two consultants available onsite. In this way, we were able to provide minimal access surgery, unlike in the first wave, where we preferred to do more open procedures as suggested by the Royal College of Surgeons.
It came with its own limitations as well. We faced a lot of challenges in terms of continuity of care as it was a different set of registrars and consultants from the various partner trusts who attended on rotation. The solution to this was to ensure an appropriate handover. This problem was solved to an extent by allocating the same SHO’s on duty for all the days of the week to ensure continuity and to update the care plan to the 2 registrars and 2 consultants who were coming in every day. The operating surgeon jointly made post-op management plans with the consultants doing the ward rounds each day.
A total of 49 surgeries were performed in the 2 month period between January 2021 and March 2021. This comprised of 20 right hemicolectomies, 13 sigmoid colectomies, 6 anterior resections and 9 other procedures. One patient underwent a redo-surgery after an initial extended right hemicolectomy, partial gastrectomy and liver wedge resection (Table 1).
Immediate post-operative care is directly linked with cancer survival rates, hence efforts were taken to ensure high standard of post-operative hospital care. The nursing staffs were additionally trained to enhance their skills at monitoring a post-operative patient, situational awareness to be responsive, in addition to maintaining ethical responsibility, concern and respect for patient dignity. Arrangements were made to improve staffing in the intensive care unit as well and patients requiring additional care were transferred back to the parent hospital without any delays.
Conclusions: The colorectal green pathway has passed the ultimate stress test. It has proved to be safe, straightforward and has shown to improve outcomes. This model should be adopted throughout the country and should form a part of the post-pandemic recovery plan with an aim to clear the waiting lists.
REFERENCES: (1) COVIDSurg Collaborative, Elective surgery cancellations due to the COVID-19 pandemic: global predictive modelling to inform surgical recovery plans, British Journal of Surgery, Volume 107, Issue 11, October 2020, Pages 1440–1449, https://doi.org/10.1002/bjs.11746
(2) Bartlett DL, Howe JR, Chang G, Crago A, Hogg M, Karakousis G, Levine E, Maker A, Mamounas E, McGuire K, Merchant N, Shibata D, Sohn V, Solorzano C, Turaga K, White R, Yang A, Yoon S; Society of Surgical Oncology. Management of Cancer Surgery Cases During the COVID-19 Pandemic: Considerations. Ann Surg Oncol. 2020 Jun;27(6):1717–1720. https://doi.org/10.1245/s10434-020-08461-2. Epub 2020 Apr 8. PMID: 32,270,420; PMCID: PMC7141488.
(3) Thousands of lives could be lost to delays in cancer surgery during COVID-19 pandemic, ICR (The Institute of Cancer Research),
Table 1.
.

Amazing technologies
P300—Initial experience with the use of the pressurized intraperitoneal aerosol chemotherapy (PIPAC) for the management of unresectable peritoneal metastasis in a newly center
Mahdi Alzamanan, S. Almowallad, T. Mahnashi, A. Aljahdali, A. Alawadhi, S. Alammari, A. Alqattan, M. Alqannas, M. Alyami, D. Guiral
King Khalid Hospital Najran, General Surgery, Saudi Arabia
Background: PIPAC is a recent approach with promising results for patients with peritoneal metastasis (PM). We aimed to evaluate survival and postoperative outcome of patients with unresectable PM from different origins treated with chemotherapy and PIPAC in newly established center in Middle East.
Methods: A retrospective analysis of a prospective maintained PIPAC database was queried for all patients diagnosed with unresectable PM who underwent PIPAC in king Khalid hospital, Najran, Saudi Arabia. PIPAC with Cisplatin 10.5 mg/m2 and doxorubicin 2.1 mg/m2 was used for gastric and ovarian PM and Oxaliplatin 92 mg/m2 was given for colorectal PM. All PIPAC were administrated over 30 min at 6-week intervals. Outcome criteria were overall survival and adverse events according to (CTCAE) version4.0. All procedures were done by well-trained surgeon on PIPAC in new established center.
Results: Forty-six PIPAC were done in 16 consecutive patients. Ten (62.5%) of the patients were male. PC was from colorectal, gastric, ovarian, in 5, 9, 2 patients respectively. Thirteen (81.3%), 10 (62.5%), 4 (25%) patients underwent a second, third and fourth, PIPAC respectively. At the first PIPAC, median age was 40 years (31–79). Median PCI was 24.5 (10–39). Four (25%) patients underwent more than 2 lines of pre-PIPAC chemotherapy. All patients had systemic chemotherapy alternating with PIPAC. Median consecutive PIPAC procedures were 2 (1–4). Overall and major complications (CTCAE—III, IV) occurred in 3 (6.5%) and 1 procedures (2.1%), respectively and no mortality. Median overall survival is 9 (2–30) months and 9 (56.2%) of patient still in life on active treatment.
Conclusions: PIPAC is safe and feasible in association with systemic chemotherapy for unresectable PM in newly established center. Survival data are encouraging and justify further clinical studies.
Amazing technologies
P301—Long-term outcomes of laparoscopic adjustable gastric band: a single surgeon’s experience
Bao-Ngoc Nasri, Daniel Jones, L. Trainor, D. Jones
Beth Israel Deaconess Medical Center, Harvard Medical School, Surgery, USA
Background: Despite many patients doing well after laparoscopic adjustable gastric band (LAGB) several studies caution offering this procedure for weight loss. The aim of our study was to review our long-term results over a decade.
Methods: Following IRB approval, the Metabolic and Bariatric Surgery Quality Improvement Program (MBSAQIP) Data Registry was used to identify LAGB placement between 2007 to 2013 by a single surgeon. We sought to determine mortality of initial operation, weight loss and resolution of comorbidities over time, the indications for revision, explantation or conversion to another weight loss operation. Chi-square test was used to analysis.
Results: From 403 LAGB performed between January 2007 to December 2013, 73 patients required band-related surgeries, including band revision and/or conversion. Mean follow-up time was 5.78 years (73.67 months). The follow-up rate at 8th year was 48% (193 patients). Hence, the rate of subsequent band-related procedures was at least 18.11%. There were 57 band removals, 9 band tubing or port revisions, 7 revisions to sleeve, 2 revisions to RYGB. The most documented indication for band-related procedures was other (25, 34.2%) including dysphagia or GERD symptoms (11), undesired band or patient requested to have band removed (5), poor weight loss (3 patients). Band slippage or prolapse (20, 27.4%) was the second most common indication for intervention. Revision procedures associated with longer length of stay compared to index procedures (2.12 days vs 1.63 days, p < 0.0001) but no statistical difference in 30_days_complication. Of those who did not require reoperation, BMI at 10th year follow-up was 37.50 from initial BMI of 42.23 with EWL of 39.22%.
Conclusions: lap band is effective for most patients with long term durability. Over time approximately one fifth will need additional surgery.
Amazing technologies
P302—Acute mesenteric ischemia during the first wave
Rachid Jabi, M. Bouziane
Mohammed VI University Hospital, Department of General Surgery Oujda, Morocco
Introduction: Acute mesenteric ischemia is the sudden interruption of the blood supply to a segment of the small intestine, resulting in ischemia, cell damage with an overall incidence of low (0.09 to 0.2%) of all acute and high emergency admissions (50–80%).
Its management is multidisciplinary by publishing the Corona virus directly as a rare and recent etiology and indirectly reducing the consultation in emergencies.
Patients and methods: Patients with Acute mesenteric ischemia diagnosed and or treated during the period between the declaration of the first case in Morocco ( 3 March) until December 31, 2020.
Results: The number of patients retained was 10 patients against 07 patients over the control period in 2019 despite the decrease in consultation activity to more than 60%.
These 10 cases are spread over 6 cases diagnosed among 1,100 patients who came for digestive symptoms and 4 cases out of 700 patients hospitalized in intensive care for Corona virus.
The male sex was dominant (70%) with a marked decrease in the mean age compared to the control period (45 vs. 64 years) and in the body mass index (20 vs. 27).
All of our patients underwent a body scan allowing the diagnosis of the infarction to be retained and the chance to discover Covid involvement in 2 patients.
Two of our patients were diagnosed one month after their Covid remission and a young patient had, alongside his pulmonary involvement, a acute mesenteric ischemia and ischemic cerebral lesions.
All our patients benefited from curative anticoagulation and explored surgically with anastomosis resection in O7 patients, stoma in 2 patients and therapeutic abstention in one patient.
The death rate in the pandemic period was 70% compared to 40% over the control period.
Discussion: Despite the decrease in emergency visits, the number of patients with Acute mesenteric ischemia was higher than that of the control period, this can be explained by the thrombogenic potential of the Corona virus and the access to diagnostic abdominal imaging.
The prognosis of this pathology is worsened with more mortality due to extensive vascular lesions, and diagnostic delay as well as pulmonary lesions complicating resuscitation measures.
Conclusion: The Covid 19 pandemic is a priority, but mortality due to other pathologies must not be neglected and digestive impairment must be taken into account with the maintenance of anticoagulation in any Covid 19 patient.
Amazing technologies
P303—Acute pancreatitis during the first wave covid 19
Rachid Jabi, M. Bouziane
Mohammed VI University Hospital, Department of General Surgery Oujda, Morocco
Introduction: Acute pancreatitis is an inflammatory condition of the pancreas most commonly caused by gallstones or excessive alcohol consumption.
The severe form comprising about 20 to 30% of patients is a potentially fatal disease with hospital mortality rate of about 15%
It is believed that up to 10% of acute pancreatitis has an infectious etiology through an immune-mediated inflammatory response.
This commentary aims to discuss whether to consider COVID-19 as a new etiology of acute pancreatitis and its impact on morbidity and mortality.
Materials and methods: Descriptive study spread over the period between the declaration of the first case in Morocco (March 3) and December 31, 2020 of patients with acute pancreatitis treated in intensive care and / or visceral surgery.
Results: The number of patients retained was 25 patients against 35 patients over the control period in 2019 despite the decrease in consultation activity to more than 60%.
Its 21 cases are spread over 19 cases diagnosed among 1,100 patients who came for digestive symptoms and 04 cases out of 13,040 for Corona virus, including 700 patients hospitalized in intensive care.
The female sex was dominant (80%) with a marked decrease in the mean age compared to the control period (45 vs. 64 years) and in the body mass index (20 vs. 27).
All of our patients underwent a pelvic body scan allowing the diagnosis of pancreatitis to be made and the Covid status to be discovered regardless of respiratory symptoms.
The lithiasis etiology was dominant in 72% of cases, followed by metabolic origin 16% and idiopathic in 12%, ie 3 patients already hospitalized in intensive care for corona virus.
Cholecystectomy was performed early in 12 patients and the number of patients requiring mechanical ventilation exceeded 30% in 3 patients were already Covid +
The SOFA score exceeded 3 in all patients treated in non-intensive care, consequently the death rate exceeded half of ventilated patients, or 4 patients in total.
Discussion: Acute pancreatitis appears to be a very rare complication of COVID-19. While COVID-19 is associated with acute pancreatitis, the need for mechanical ventilation appears to be greater and kidney failure further complicates the management of its patients.
Conclusion: Direct action of the virus on the parenchyma and pancreatic vessels showing ACE2 receptors and systemic inflammation during the initial stage of PA due to a deregulated immune response leading to organ failure and worsening the patient's prognosis.
Amazing technologies
P304—Laparoscopic surgery for epiphrenic esophageal diverticulum
Alim Akbarov, Ramazan Eryılmaz, ÜE Çelik, İB Gök, R. Eryılmaz
Akdeniz University, General surgery, Turkey
Esophageal diverticula are divided into three types according to their localization and characteristic pathophysiology: Epiphrenic diverticula, Zenker's diverticula, and Rokitansky's diverticula. Epiphrenic diverticulum is a rare condition and its prevalence in the population is between% 0,015–0,018. Epiphrenic diverticulum is a pulsion-type diverticulum usually located in the distal esophagus. Histologically it has a pseudo-diverticular appearance without a muscle layer. Distal esophageal motility disorder accompanies 75% of the cases. Although the cause is unclear, epiphrenic diverticulum is usually localized in the right wall of the esophagus. Most of the diverticulum is asymptomatic. Routine clinical and endoscopic follow-up is generally recommended in asymptomatic patients with diverticula smaller than 5 cm. In symptomatic patients, the standard treatment is surgery. In this presentation, we share a 63-year-old female patient who presented with dysphagia and epigastric pain after eating solid foods. In the preoperative esophagogastroscopy, a giant diverticulum containing food debris was detected in the 38th cm of the esophagus, just above the esophagogastric junction. No abnormality was detected in manometry. The patient underwent laparoscopic diverticulectomy. In the post-operative period, the patient did not have any complaints, and fluoroscopy with barium swallow test was performed for control purposes.
Amazing technologies
P305—Patient-reported scar assessment of single-port versus multi-port laparoscopic appendectomy for acute appendicitis: a retrospective two-institutional Study
Sung Uk Bae, K.E. Kyeong Eui, W.K. Jeong, S.K. Seong Kyu
Keimyung University Dongsan Hospital, Surgery, Korea
Background: Considering the treatment for acute appendicitis, conventionally multi-port laparoscopic appendectomy (MPLA) is standard procedure. Recently, single-port laparoscopic appendectomy (SPLA) was introduced as a less invasive technique compared to conventional procedure. Although previous studies compared between SPLA and MPLA showed safety of MPLA, few studies reported of the advantages of MPLA for acute appendicitis.
Materials and methods: A retrospective study from prospectively collected data of 47 single-port laparoscopic appendectomy cases and 51 multi-port laparoscopic appendectomy cases from August of 2014 to November 2017 was evaluated.
Results: Patient demographics and preoperative laboratory values were comparable. In operative outcome, there was no statistically significant difference in the severity of appendicitis, blood loss, diameter and length of appendix but operative time and incision length was both shorter in single-port method. In postoperative outcome, there was no statistically significant difference in hospitalization length, postoperative complication rates (ileus, surgical site infection), or readmission in both groups. The POD 0 analgesic uses was lower in SPLA group (p = 0.011) The Scar assessment Questionnaires were obtained and SPLA group had superior overall outcome than MPLA group (p = 0.026). Total score, appearance, consciousness showed statistically significant difference, while satisfaction with appearance and satisfaction with symptoms scale did not.
Conclusion: Single-port laparoscopic appendectomy is also safe and feasible compared to multi-port laparoscopic appendectomy. Less uses of analgesics on operation day, smaller sizes of total incision, and less procedures times was showed in single-port laparoscopic appendectomy. Appearance and consciousness of the scar after single-port laparoscopic appendectomy was found superior compared to those of multi-port laparoscopic appendectomy.
Amazing technologies
P306—Liver echinococcosis. Choose open surgery. Choose laparoscopy. Choose robotic surgery. Choose the best way for improving surgery results
Alexey Shabunin, Alexey Karpov, M.M. Tavobilov, V.V. Bedin
Botkin Hospital, HPB, Russia
Background: New technologies provide a paradigm shift of liver echinococcosis treatment.
Material and methods. The surgical clinic of the Botkin Hospital has experience of 300 operations for liver echinococcosis. Open, laparoscopic and robotic interventions have been used for liver echinococcosis. During the period from 2007 to 2020, 200 open pericystecomies, 21 minimally invasive operations were performed: 11 laparoscopic and 10 robotic. The study evaluated postoperative complications according to the Clavien-Dindo classification, specific complications according to ISGLS, and relapses during the first year after surgery.
Results: Comparing immediate and long-term results, no differences were found in the duration of the operation, the frequency of transfusion of blood components, the incidence of severe postoperative complications (class III and more according to Clavien – Dindo), the presence of specific complications according to the ISGLS classification. Minimally invasive operations were accompanied by statistically significantly less blood loss compared to open ones: 45 (0–310) ml and 177 (70–586) ml (p < 0.001), respectively, as well as shorter inpatient treatment: 3 (1–6) and 14 (7–38) days (p < 0.001).
Conclusion: Thus, laparoscopic and robotic technologies find their place in hydatide liver lesions treatment. These modifications of traditional surgical procedures reduce the number and severity of postop-erative complications and improve treatment results.
Amazing technologies
P307—The impact of intraoperative endoscopy in colorectal anastomotic leakage: a Tunisian single center experience
Mohamed Aboulkacem Bourguiba1, F. Souai2
1Bourguiba Medical Center, general surgery, 2FSI Hospital, general surgery, Tunisia
Background: Anastomotic leakage is a serious postoperative complication in colorectal surgery increasing the morbi mortality and affecting the oncological outcomes. The aim of our study is to evaluate the impact of the intraoperative endoscopy in preventing colorectal anastomotic leakage.
Methods: from April 2017 to Juin 2021, all colorectal anastomosis done in our institution were investigated per operatively using flexible endoscopy. In every procedure, we checked the aspect of mucosa, bleeding and anastomotic integrity (no bubbling). Data of all patients were collected in a prospective database and analyzed.
Results: a total of 103 patients were enrolled. the median age was 65,81 years. Male gender was 1,2. Median BMI was 28 kg/m2. Colorectal resection was done in 65% for oncologic disease and 35% for benign disease. Laparoscopic approach was done in the majority of cases (72,8%). The type of the anastomosis was ileorectal in 9,7%, colo colic in 10,6% and colorectal in 78,7%. 68% of patients underwent a high pelvic anastomosis. The intraoperative findings were: a normal peri-anastomotic mucosa in 90 patients (87%), peri-anastomotic bleeding in four (4%) patients controlled with trans parietal stitch, air leak in five (5%) patient who had an immediate suture reinforcement and ischemic or congestive peri anastomotic mucosa in four (4%) patients who underwent an immediate anastomotic takedown and re-creation. A symptomatic postoperative anastomotic leakage was noticed in two patients (2%). The mortality rate was 0,9%.
Conclusion: intraoperative endoscopy is a safe and reproductible method to detect and prevent postoperative anastomotic colorectal leakage. However, it is not effective in 100% of cases.
Amazing technologies
P308—Our experiende in urgent approach via tapp of complicated inguinal hernia
Ana Isabel Aguilar Márquez1, Alberto García Reyes1, M. Infantes Ormad1, P. de la Herranz Guerrero1, M. Retamar Gentil1, J. Reguera Rosal1, Y. Lara Fernández2, F. Oliva Mompeán1, J.A. López Ruiz1, B Marenco de la Cuadra1
1Hospital Universitario Virgen Macarena, Cirugía General y del Aparato Digestivo, 2Hospital de Riotinto, Cirugía General y del Aparato Digestivo, Spain
Maingoal: Complicated inguinal hernia is one of the most common emergencies. Laparoscopic approach is gaining ground on account of it offers the possibility of asses the incarcerated intestine directly while hernia is being repaired. We show our experience with TAPP approach in complicated inguinal hernia in our hospital.
Methods: We present an observational retrospective study with 17 patients who have needed urgent laparoscopic treatment of inguinal hernia from 2016 to the present. The technique was made in the same way in all of patients: three ports, one of 11 mm and two of 5 mm. Hernial content is reduced with or without chelotomy and in this moment we can assess the incarcerated intestine. Afterwards, we make peritoneal flap and dissect the spermatic cord’s elements and hernial sac in order to put a preperitoneal polypropylene mesh that we attach to pubis. Finally, peritoneum is closed with barbed or helical suture.
Results: We present to 17 patients, 52,94% of whom were women and the main age was 69 years. 10 patients (58,81%) attended to hospital with complicated inguinal hernia, with 3 recurrences, and the rest were complicated femoral hernias (41,17%). In all cases we made a TAPP approach allowing of recover the intestine during hernial reparation with the exception of one patient. In this case it was required to convert to open surgery because of an ischemic perforation and then, we made an extracorporeal resection and mechanical anastomosis. We used polypropylene meshs, attached with helical sutures, 10 of whom were preformed to laparoscopy. In 15 patients peritoneal flap was closed with barbed suture, in one case with helical suture and in the conversion with slow absorbable monofilament of 2/0. The average length of stay was 3 days. The intraoperative complications were two port bleedings (11,76%) and one accidental bladder opening. As for minor complications: 3 seromas (17,64%), an haematoma (5,88%) and one wound infection (5,88%). Any cases needed reintervention or readmission to hospital.
Nowadays, in 3 patients we finalized the two years of follow up without hernial recurrences, but there is one case in the remaining group (5,88%).
Conclusions: TAPP approach allow to assess the incarcerated intestine and make a resection if it was necessary. We can repair the hernia with this via or, in case we need to do an intestinal resection and we have fecal spilled it allows make and anterior approach and maintain isolated both surgical fields. Once the learning curve is over there is no difference in terms of surgical times, recurrences, bleedings or wound infections and we have the laparoscopic advantages.
Amazing technologies
P309—Rare case of extensive gastric pneumatosis and portal gas
Alberto García Reyes, A.I. Aguilar Márquez, O. Alpizar Rivas, J. Reguera Rosal, C. Torres Arcos, F. Oliva Mompeán, J. Valdes Hernandez
Virgen Macarena University Hospital, General Surgery, Spain
We present a 64-year-old man who was a drinker with no other personal history of interest, who came to the emergency room due to months-long abdominal pain and vomiting.
The examination revealed abdominal pain and distension.
They performed a CT of the abdomen that reported a gastric an duodenum dilatation, with pneumatosis of its wall and porto-mesenteric gas secondary to a lesion suggestive of duodenopancreatic neoplasia (Figure).
Given the clinical stability, we decided to decompress using a nasogastric tube, antibiotic treatment, and close monitoring.
During his admission, the patient presented a good evolution, with disappearance of gastric and portal pneumatosis in a control CT scan performed on the third day, being discharged on the fifth day.
Currently, it is under study for pancreatic injury.
Discussion
Portal venous gas was first described by Wolfe and Evens in infants with necrotizing enterocolitis. It is associated with numerous underlying abdominal diseases, ranging from benign causes to life-threatening conditions that require immediate surgical intervention.
Although gastrointestinal pneumatosis or hepatic portal venous gas do not always imply intestinal ischemia, the coexistence of both entities is highly suggestive of transmural intestinal infarction, which implies high mortality rates, and in the case of portal gas, a mortality between 75 and 95% of cases.
Portal gas can be diagnosed by abdominal X-ray, ultrasound and abdominal CT, being this the one with the highest sensitivity.
This entity requires early treatment with broad spectrum antibiotics, fluid therapy and urgent surgery in certain cases.
In conclusion, intramural gastric gas, even associated with portal venous gas, does not always require surgical intervention, and each case must be individualized based on the patient's evolution.
Amazing technologies
P310—Pilot study to assess the role of minimal access surgery in the management of superficial surgical infections
Yashwant Rathore, R Goyal, S Chumber
All India Institute of Medical Sciences, Department of Surgical Disciplines, New Delhi, India
Introduction: An abscess is defined as a walled-off cavity containing pus (dead neutrophils), i.e., a localised collection of infected material secondary to inflammatory response mounted by the body’s defence mechanism. The standard treatment for an abscess since time immemorial has been Incision and Drainage (I&D) without primary closure at most sites. Post I&D, pain and ugly scar are the most common complaints in these patients. In this study, we have evaluated the role of minimal access surgery (MAS) in the management of superficial surgical infections.
Materials and methods: This was a prospective, non randomised, ethically approved, clinical interventional study, comparing the clinical and cosmetic outcome between patients undergoing conventional I&D of superficial abscesses and those undergoing MAS drainage (Fig. 1 insertion of 5 mm port in breast abscess cavity& Fig. 2-aspiration of pus).
Results: A total of 50 patients were recruited, out of which 2 patients had spontaneous rupture. 25 patients underwent I&D and 23 underwent MAS drainage. Mean age was 35.8 ± 13.5 years, mean size of the abscess was 6 ± 1.9 cm. Baseline characteristics like age, sex distribution, duration of symptoms, size of the abscess and volume of the pus drained were comparable between the two groups. Resolution of pain and redness was achieved earlier in MAS drainage compared to conventional I&D. Resolution of induration was statistically insignificant. Duration of the need for dressing and duration of return to daily activity was less with MAS drainage. Scar size was significantly less in MAS drainage group. Staphylococcus aureus was the most common organism isolated, and both groups had comparable rates of complications and recurrences.
Conclusion: Our study has shown that, MAS drainage offers earlier recovery along with better cosmetic outcomes.

Amazing technologies
P311—Adrenocortical carcinoma: case series reports and literature review
Emad Rezkallah1, W.M. Elsaify1, A. Elsaify2, Y. Mahmoudd1
1South Tees NHS foundation Trust, General Surgery, United Kingdom. 2Misr University for Science and Technology, Medical School, Egypt
Introduction: Adrenocortical carcinoma (ACC) is a rare endocrine malignancy that arises from the adrenal cortex. ACC is a highly aggressive tumor with a high rate of recurrence. The main predictors of recurrence include advanced disease stage, incomplete surgical resection, cortisol production, certain genetic alterations, and high proliferation rate (Ki-67 proliferation index). Objectives: the main objectives of our study are to summarize our current practice regarding the management of ACC, to assert the challenges in the diagnosis and management of cases of ACC and to illustrate the clinical outcomes post-surgery. Design: Retrospective analysis of five cases presented with features of ACC and had adrenalectomy during the period between 2014 and 2020. Methods: retrospective review of all patients’ data including age, clinical presentation, radiological findings, hormonal profile, operative management, adjuvant treatment, complications, follow up and survival. Results: The mean age was 53.8 ± 8.41. Females were more affected than males. Three cases presented with functioning ACC, while 2 cases had non-functioning ACC. The average tumor size was 12 cm. All the 5 tumors weighted more than 100 g. Four cases had metastasis; 2 cases presented with metastatic disease and 2 patients developed metastasis on follow-up post operatively. We found that cases associated high Ki67 proliferation index, were associated with a more aggressive disease (Figs. 1, 2). Conclusion: ACC is a highly aggressive malignant tumor with poor outcomes. Early diagnosis, localized disease and clear surgical margins provide the primary treatment for stages I to III. Because of the high rate of recurrence, adjuvant treatment options should be considered in high-risk patients (e.g. Mitotane, radiation therapy of the tumor bed and/or chemotherapy). Despite our current knowledge about ACC, more international efforts are required to identify new therapeutic targets to improve the management of ACC patients.

Amazing technologies
P312—10 Years of experience of a single surgeon in adrenalectomy: retrospective review
Emad Rezkallah1, W. M .Elsaify1, A. Elsaify2
1South Tees NHS Foundation Trust, General Surgery, United Kingdom. 2Misr University for Science and Technology, Medical School, Egypt
Objectives: The aim of the current study is to review patients underwent adrenalectomy either open or laparoscopic in our surgical department by the same surgical surgeon, focusing on the final diagnosis, type of operation and complications. Methods: retrospective review of patients who underwent adrenalectomy in our surgical department during the period from 2011 to 2021. Patients’ data include age, sex, hospital stay, blood loss, operative time, tumor size, final diagnosis and complications.
Results: during the 10 years, 88 patients underwent adrenalectomy. The patients’ mean age was 56.653 ± 14.28 years of age. 35 of patients were males (39.77%) and 53 were female (60.23%). Average blood loss was 49.5 ± 19.49 ml. The mean hospital stay was 4.15 ± 3.6 days.
Conclusion: Over 10 years, the increased level of experience was associated with reduced operative time, less blood loss and lower rate of complications. Laparoscopic adrenalectomy was associated with better clinical outcomes when compared with open surgery. Laparoscopic adrenalectomy can be performed safely even with tumors larger than 12 cm.
Amazing technologies
P313—Clip migration after cholecistectomy
Alberto García Reyes, O. Alpiza Rivas, M. López-Cantarero García-Cervantes, J.A. Bellido Luque, I. Sánchez-Matamoros Martín, A. Nogales Muñoz
Virgen Macarena University Hospital, General Surgery, Spain
We present a 43-year-old woman who underwent cholecystectomy with choledochotomy and laparoscopic lithoextraction for choledocholithiasis, who came to the emergency room due to abdominal pain of 3 days of evolution.
An abdominal CT scan was performed that reported a possible cholangitis with liver abscess at the level of segment VI, with material of metal density near to the lesion. The inflammatory process extended to the right iliac psoas.
The patient was clinically stable, so surveillance and antibiotic therapy were decided. During admission, an MRI cholangiographywas performed with decreased liver collection, being discharged on the seventh day.
During the follow-up, a CT scan was performed with a decrease of liver collection but an increase in retroperitoneal collection, performing percutaneous drainage with their resolution.
Discussion
The ligation of the artery and cystic duct is performed with titanium staples, which can migrate to the common bile duct and cause stenosis, abscesses, pancreatitis and cholangitis.
Migration of the surgical clip to the common bile duct is a rare complication after laparoscopic cholecystectomy.
Despite the significant number of cholecystectomies performed and the fact that clips are the most popular ligation method, < 100 cases of clip migration to the common bile duct have been reported, with a mean time of 2 years.
The mechanism is poorly understood and multiple hypotheses have been proposed, highlighting the increase in pressure of the structures adjacent to the cystic duct causing its inversion or due to an ineffective section of the cystic duct leading to leaks and chronic inflammation.
Although most patients can be treated by ERCP, in up to 20% of cases it fails, becoming real surgical challenges.
In conclusion, clip migration is a very rare complication after laparoscopic cholecystectomy, and each patient must be assessed individually to decide the most appropriate treatment.
Amazing technologies
P314—Coagulation Screening in Patients admitted to the Acute Surgical Receiving Unit—Ninewells Hospital, Dundee, Scotland
Dariusz Gunia, D. Porter, C. Payne
Ninewells Hospital/NHS Tayside, General Surgery, United Kingdom
Aim: Establish whether compliance to guidelines for routine pre-operative coagulation screening set by the National Institute for Health and Care Excellence (2016) is used on general surgical patients.
Objective: Observe set components from guidelines with respect to the admission, dependent on grade of surgery and patient’s ASA grade. To determine financial loss per year from inappropriate/unnecessary coagulation testing performed on patients.
Method: Review of all coagulation screening bloods taken for general surgical admissions to the acute surgical receiving ward over a 2 week period. The cost of one coagulation screen in NHS Tayside is £2.69. Clinical notes were reviewed in order to determine if criteria was met for performing a coagulation screening on admission. The results of the initial audit were presented at the Clinical Effectiveness meeting. The audit was repeated 2 weeks following a teaching session.
Results: 200 individuals were included in the first cycle of the audit. It was found that 168 tests were ordered (161 unnecessary, 7 correctly screened, and 32 patients excluded appropriately). During the re-audit 208 patients were involved, and 153 tests were performed (151 unnecessary, 2 correctly screened, 55 patients excluded appropriately.
Conclusion: As a result of the audit, coagulation screen sampling had decreased from 80.5% to 72.6%, an improvement of 7.9%. This equated to a savings of £26.90 over the duration of audit period (£699.20 per annum). This audit has demonstrated a change in clinical practice with potential significant financial benefit for the NHS.
Amazing technologies
P316—Treatment of enteroatmospheric high-output small-bowel-fistulae and preconditioning of inflammatory perifistular skin using a temporary PFO-occluder system
Günther Winde1, E.W. Kolbe1, M. Kalandarishvili1, T. Köhler2
Klinikum Herford, University Clinic of the Ruhr University Bochum RUB, 1University Dept. of General and Visceral Surgery, 2University Dept. of Anesthesiology and Intensive Care Medicine, Germany
Introduction: Enteroatmospheric small-bowel fistula are often a consequence of repeated re-laparatomies after peritonitis of different roigine, e.g. after traumatizing the bowel wall followed by disturbed perfusion but in the majority of cases because of insufficient surgical treatment in advance of secondary healing with frozen abdomen and abdomen apertum with adhesive intestinal loops. Vacuum sealants are commonly used to improve the wound management but even provoces theformation and aggravation of small bowel fistulae. The management of fistulae near the bowel wall with height differences is another problem, a large mucosal prolaps and high-output fistula are special problems with longtime hospital stay. We report about our operative results and use of a preconditioning fistula closure device.
Patients and methods: 28 patients (mean age 76 years, M: F = 10:13) were treated between 2012—2020 having a Grade 3B/Grade 4 fistula (Björck classification).
In all patients a PFO-occluder-system (St.Jude Medical, Eschborn, Germany) was implanted with the intention of a temporary reduction of the fistula-output. Relaparatomy was accompanied by fistula resection with parts of the bowel, bowel wall closure usually needs a Ramirez-plasty on both sides, collagen-meshes were used in cases if intestinal loops were only covered by the skin.Only absorbale suture material was used. Main goal was to perform a single anastomosis only. Underlying diseases were CED (2/28), peritonitis with programmed relaparatomies 17/28, of whom 10/17 had cancer without peritoneal cancer, pancreatitis 2/28, bowel perforation while under chemotherapy7/28.
Results: Inhouse-treatment before starting the salvage therapy lated 39–17 weeks. Discharge followed the fistula-closure within 28 days in 20/28 cases. In 10/28 cases the occluder lead to a simple wound-dressing, others were managed by stoma-bag-treatment.In a single case the hypergranulation over the occluder lead to a definitive fistula closure. In 27/28 cases the precondtioning of the inflammatory reaction of the perifistular skin was achieved. In 4/28 cases an additional muscular bridge from the abdominal wall down to the occluder and the fistula was done to improve the local perfusion and fibrin sealing. In 27/28 cases the final relaparotomy with bowel resection including the fistula bearing part was followed by one further relaparotomy due to an unexpected stenosis of an preexisting ileorectal anastomosis which was insufficiently cleared before. Primary wound healing was reached in 17/28 cases, the remaining cases had s.c.-VAC-dressings or even p.s.-healing. One patients died due to an aggravated episode of the underlying plasmocytoma.
Conclusions: The PFO-occluder serves mainly a a temporary device to improve the inflammatory skin by reducing the fistula output. The meantime can be used to improve the nutritional status of patients, improving a chronic renal failure and liver function (albumin > 3 g/l). The definitive solution of enteroatmospheric fistula treatment is the final resection with possibly only single anastomosis performed. In all cases the initial opening for the final surgical intervention should always start fare away from all other abdominal scares, preferably epigastrical. In all cases an initial fundmental relaparotomy would have prevented months of hospitalization.
Amazing technologies
P317—An uniportal video-assisted thoracoscopic blebectomy be indicated for every located spontaneous pneumothorax?
Masao Naruke
International Goodwill hospital, General Thoracic surgery, Japan
Aim: Uniportal video-assisted thoracoscpic surgery (VATS) for spontaneous pneumothorax (SP) has been more widely used recently. In this study, we investigated our initial experiences with uniportal VATS blebectomy on the procedure regarding possible blebs location.
Method: We reviewed 9 cases of uniportal VATS stapler blebectomy for primary SP, performed on patients under 45 years of age, between 2015 and 2019. In principal, a single port of 2.5 cm on the 5th intercostal space at the anterior axially line was fixed with the use of the silicon wound retractor. Their blebectomies were performed using a simple technique using conventional straight endoscopic instrument, cotton-made dissectors, thoracoscopic Maryland grasping forceps, Endo GIA stapler, and 30-degree 5-mm endoscope. In the case of adhesion dissection, the energy device was used. Following bullectomy, the stapling line was reinforced with an absorbable polyglycolic acid sheet or absorbable hemostat sheet. Neither pleurectomy nor pleurodesis was added.
Result: The patients underwent stapler blebectomy for the blebs located in right apical segment, right superior segment, right middle lobe, left apical-posterior segment, and left anterior-basal segment.
In every procedure, 1–3 sites of lung were wedge-resected with neither additional ports or open extended incision. Blood losses were negligible and mean operation times was 72.8 ± 16.65 min.
Instruments movements were limited due to the access port, however all procedures could be accomplished with the ingenious use of camera handled by an assistant.
Conclusions: A uniportal VATS blebectomy could be performed for every located blebs in our cases. However, due to the limitations of the procedure, it is believed that other types of VATS are needed to treat other types of blebs.
Amazing technologies
P319—Elective Treatment of pilonidal cyst with lasertherapy
Carmen Maillo-Oliva, R. Camacho-Abreu, G. Piçarra, M.J. Oliveira, E. Gaspar, J. Sacadura-Fonseca
Hospital Lusíadas Lisboa, General Surgery, Portugal
Introduction: Pilonidal cyst is a frequent disease with an incidence of 26/100,000 inhabitants in occidental countries. The treatment is surgical and consists in excision of the cyst with margens and closure, excision with open healing or marsupialization. Any of those treatments are long and painful. The recurrence rate is high, increasing with the time of follow-up.The new treatment with debridement and laser therapy was designed to treat without postoperative pain and with low need of medical assistance during the healing.
Methods: We treated electively 50 consecutive patients by curettage and cauterization of the sinus with laser energy with a radial probe. All patients were discharged in the same day and after the first cases we started to operated under sedation. All patients signed an informed consent.All patients had to remove the hair to the perianal area.
Results: 50 patients; Mean age 28,28; Months of symptoms 22,11; 8/50 were relapses; Mean size of the bigger tract 3,58; weeks of draining 3,48; weeks to closure 6,3; application of silver nitrate in 7/50; antibiotic 5/50 and relapses 4.If we evaluate the result of the relapsed sinus: number 8; mean age 34,88, Months of symptoms 35,3; size 4,625; weeks of draining 3,14; time of closure 5,85; silver nitrate 2 and 0 relapsesAll patients tolerated well the procedure and would do again if needed.
Conclusion: Minimally invasive treatment with laser therapy for pilonidal cysts is safe, well tolerated and with good results in terms of recurrence, although the follow-up is short.
Amazing technologies
P320—Surgical hemostatic technique in liver resections with subcentimetric margin: could be improve oncological results? A propensity Score Matching study
Eva María Pueyo-Périz1, M. Villamonte1, A. Andaluz2, X. Moll2, E. Berjano3, L. Grande1, M. Pera4, B. Ielpo1, F. Burdío1, P. Sánchez-Velázquez1
1Hospital del Mar, Hepatopancreatobiliary, 2Facultad Veterinaria, Universidad Autónoma Barcelona, Department of Medicine and Animal Surgery, 3Politècnica de Valencia, Department of Electronic Engineering, 4Hospital del Mar, Surgery, Spain
Background: The role of radiofrequency (RF) energy application on resection margins and its relevance in local recurrence (LR) remains unclear at this time. Our objective was to compare the effect on LR of the intraoperative application of RF energy and conventional technologies on the hepatic resection margin.
Methods: We retrospectively analyzed 283 patients admitted from September 2006 to February 2020 who underwent hepatectomy. After propensity score adjustment, patients were classified into two groups according to the haemostatic device used: RF applicator (AMC Group, n = 83) and conventional haemostatic devices (Control Group, n = 83). Analyses of LR and overall survival (OS) were performed using the Cox proportional hazard model and Kaplan–Meier survival.
Results: No significant differences were observed between the groups in clinical baseline characteristics. The estimated 1, 3, and 5 year LR rates of patients in the Control and AMC Group were: 93.5%, 86.0%, 81.0% and 98.8%, 97.2%, 91.9%, respectively (p = 0.049). The LR rate was significantly higher in the Control than AMC Group: 12 patients (14.5%) vs. 4 patients (4.8%) (p = 0.039). Univariate Cox analyses indicated that the use of the RF applicator was significantly associated with lower LR (Hazard ratio = 0.29, 95% confidence interval 0.093—0.906, p = 0.033). The Control Group showed smaller coagulation zone widths than the AMC group (p < 0.001).
Conclusions: RF energy application seems to produce less local hepatic recurrence than the convectional haemostatic technologies.
Amazing technologies
P321—The stability of novel synthetic peptide-type hemostatic agent "TDM-623" on digestive enzyme exposure
Yuto Kubo1, T. Kobayashi2, N. Yamamoto2, K. Isaka3, K. Yamashita4, T. Saito4, K. Tanaka4, T. Makino4, T. Takahashi4, Y. Kurokawa4, M. Yamasaki4, H. Eguchi4, Y. Doki4, K. Nakajima1
1Graduate School of Medicine, Osaka University, Department of Next Generation Endoscopic Intervention (Project ENGINE), 23-D Matrix, Ltd, 3Fuso Pharmaceutical Industries, Ltd, 4Osaka University, Graduate School of Medicine, Department of Gastroenterological Surgery, Japan
Background: There is an increasing necessity to cover artificial ulcers associated with endoscopic submucosal dissection (ESD) to prevent postoperative bleeding and perforation. This is further necessitated in case with the patients under anticoagulant therapy, which has been increasing in aging societies. A synthetic peptide is a promising hemostatic agent that can be theoretically applicable via flexible endoscope in gastrointestinal tract. However, it’s stability against gastric / pancreatic secretion has yet to be shown.
Purpose: The aim of this study was to verify the stability of TDM-623 on digestive enzyme exposure.
Methods: A synthetic peptide-type hemostatic agent “TDM-623” (1 mL) was applied in 10 cm dish and left at 37 °C in a humidified incubator with 5% CO2 for gel formation (n = 10, respectively). Artificial gastric juice, artificial pancreatic juice and saline were applied in each dish. The stability of TDM-623 was evaluated at 0, 15 and 30 min, 1, 6, 12, 24, and 48 h, respectively. The evaluation methods were (1) the amount of peptide dissolved in the solvent by high performance liquid chromatography, (2) morphological changes by photograph and eosin staining, as well as physical changes by weight measurement.
Results: (1) The dissolved peptides originated from TDM-623 gel were observed at all exposure times except for the base line (0 min exposure) on gastric juice exposure. However, each dissolved amount was negligible compared to its original amount: maximally 10.3% after 48 h. No significant amount of dissolved peptides was seen at any exposure time on pancreatic juice exposure. (2) There were neither morphological nor physical changes in TDM-623 structures after exposure to digestive enzymes for 48 h.
Conclusion: This study suggests that TDM-623 is sufficiently stabile under digestive enzyme exposures. TDM-623 is thus expected as durable hemostatic agent which may protect artificial ulcer left by ESD, to prevent postoperative bleeding and perforation.
Amazing technologies
P322—Our surgical strategy for secondary pneumothorax in patients with interstitial pneumonia and evaluation thereof
Hirotoshi Kubokura, J. Okamoto, N. Yoshino, J. Usuda
Nippon Medical School Musashikosugi Hospital, Thoracic Surgery, Japan
Background: Surgical treatment of secondary pneumothorax in patients with interstitial pneumonia (IP) is substantially difficult than that of common pneumothorax for consolidated and fragile lung tissue. This, along with patient’s conditions (e.g., low lung function and steroid use), underlies poor outcomes of the surgery for secondary pneumothorax in patients with IP.
The surgical policy for this condition in our department has been as follows: 1) indicating surgery for patients with distinct air leakages; 2) shortening the duration of operation by performing mini-thoracotomy without port video-assisted thoracoscopic surgery; and 3) ensuring closure of pulmonary fistula through ligation of perforated bullae, rather than stapling, to avoid anastomotic leakage.
Objective: In this study, 10 cases of secondary pneumothorax in patients with IP treated according to this surgical policy were reviewed and evaluated.
Subjects: A total of 323 cases of thoracoscopic surgery were performed for pneumothorax (excluding catamenial and traumatic pneumothorax) in our department during a 10-year period from January 2010 to December 2019. Among these, surgery was performed for pneumothorax secondary to IP in 10 cases (7 patients) (pneumothorax secondary to IP was defined as pneumothorax in patients who had been diagnosed with IP and treated on an outpatient basis preoperatively or in patients who were clearly considered to have IP on imaging).
Results: In the IP group, the mean age was 71.9 (56–79) years, with all patients being males. However, the non-IP group had a mean age of 32.4 (13–89) years, with a male: female ratio of 275:38. The mean durations of operation in the IP and non-IP groups were 62.5 ± 20.7 and 67.2 ± 31.8 min, respectively, indicating no difference. The duration of postoperative drain placement was 1.10 days in the IP group and 1.19 days in the non-IP group; the drain could be removed on the day after surgery in 9 of the 10 patients in the IP group. However, one patient in the IP group presented recurrence of air leakage and subcutaneous emphysema accompanied by cough on the morning of the day after surgery; hence, this patient underwent emergency reoperation on the same day (the drainage tube was removed on the day after reoperation).
Conclusion: The postoperative courses were particularly favorable in the 10 cases of secondary pneumothorax in IP patients treated according to our surgical policy. Here we present the clinical background, imaging data, and intraoperative findings of these cases, along with a review and reflection of the case that required reoperation.
Mazing technologies
P323—Incidental finding of large mesenteric cyst in young female, laparoscopic excision
Thabet Alghazal
King Fahad Specialist Hospital -Dammam, General Surgery, Saudi Arabia
INTRODUCTION: Mesenteric cysts are rare intra-abdominal benign tumors. They commonly originate from the small bowel mesentery, although a proportion has been found to originate from the mesocolon (24%) and retroperitoneum (14.5%)0.1 They are a rare cause of abdominal pain and are discovered incidentally. If symptomatic, the most common presenting complaint is abdominal pain (55–82%), followed by the complaint of an abdominal mass (55–61%) and the sensation of abdominal distention (17–61%). Diagnosis is extremely difficult since its symptomatology can resemble any abdominal disease.2performing physical examination and conducting radiological investigations such as ultrasonography (USG) and CT are the key to the diagnosis. Surgery is the treatment of choice, as a complete resection with negative borders is curative and prevents recurrence.3 We present a case of a 31-year-old patient, large cystic mass was identified in her lower abdomen. After proper evaluation and surgery patient successfully recovered. The large simple mesothelial cyst was the final diagnosis. CASE REPORT The patient is a 31-year-old female patient, medically free, mother of 2 children, referred to general surgery clinic due to CT scan finding of a large pelvic cyst, for further evaluation. She was complaining of vague on and off abdominal pain, mainly epigastric, lower abdomen, and pelvic area for three months. She had a history of abdominal distention with no other abdominal symptoms nor had a history of abdominal trauma. No H/o weight loss. On examination: there was a swelling in the lower abdomen felt. All blood investigations including the tumor markers were within normal limits including CA 19–9, CEA, alpha-fetoprotein, and CA 125. CT scan report brought from outside and suspect of lymphangioma. MRI showed a large non-enhancing fluid intensity area occupying the pelvic and lower abdomen approximately 7.4 cm * 13 cm * 40 cm sized, a clear fluid containing lesion in the peritoneal reflection (within the peritoneal cavity). It causes displacement of the small bowel loops superiorly. The outline is flabby, with no septations or mural nodules. There is an extension of the cyst into the right side of the pelvic and abutting the right ovary, however, it appears to be separated from ovarian tissue. No focal lesion is seen in retro-peritoneal. There was no solid component representing lymphangioma. Possibility of the omental cyst to be considered. Decision made to do laparoscopic exploring and cystic resection. During the operation, a large peritoneal cyst has been evaluated located in the lower abdomen, attached to the anterior abdominal wall, pelvic and to the dome of the urinary bladder. The cyst separated from its attachment by using the LigaSure energy source. Cystic fluid aspirated and sent to the cytopathology lab which showed a result of negative for malignancy. After full aspiration of the fluid, the cyst is completely extracted through 10-mm trocar, specimen sent to pathology which showed a simple mesothelial cyst. CONCLUSION: A mesenteric cyst is a rare intra-abdominal tumor, present with varied and non-specific, from asymptomatic patient to severely ill patient with peritonitis, perforation and death. Mesenteric cyst must be considered in the differential diagnosis of a cystic lesion within the abdominal cavity. Ultrasonography and CT are the most useful imaging modalities for diagnosing mesenteric cysts. The treatment of choice of mesenteric cyst is surgical resection for both benign and malignant cysts. Complete surgical excision is the treatment of choice. Following surgery, the prognosis is excellent and recurrence is low. Laparoscopic resection has a high success rate with a low incidence of postoperative complications. There are nice Intraoperative Laparoscopic pictures and CT scan, MRI and Histopathology Pictures.
Amazing technologies
P346—Adoption of minimally invasive surgery: publication trends from 1980 to 2020
Moustafa Abdalla1, S. Abdalla2, D. Jones3
1Harvard Medical School, Department of Surgery, USA. 2University of Toronto, Department of Computer Sciecne, Canada. 3Beth Israel Deaconess Medical Center, Department of Surgery, USA
Objective: Coined in 1986, ‘minimally invasive’ was (and is) used to describe procedures that involved making very small (or no) incisions for the surgical treatment of illness and anatomic pathologies that were traditionally treated using open (or more invasive) approaches. Here, we sought to examine changes in the surgical literature as a means of probing and quantifying the adoption of this innovation, split by procedure, organ, and procedure type.
Methods: Our analysis focused on 8 broad categories: biliary surgery (cholecystectomy, common bile duct exploration, cholecystojejunostomy), foregut surgery (Nissen fundoplication, paraoesophageal hernia, heller myotomy, partial gastrectomy, peptic ulcer disease, gastrojejunostomy), enteral access (gastrostomy [T-fastener’s technique], Janeway Permanent gastrostomy, jejunostomy), obesity surgery (Roux-en-Y gastric bypass, adjustable gastric banding), solid organ (hepatic resection, adrenalectomy, distal pancreatectomy, splenectomy, nephrectomy), thoracic (pulmonary wedge resection, esophagectomy), hernias (transabdominal preperitoneal repair [TAPP], totally extraperitoneal repair [TEP], ventral), and colorectal (right colectomy, left colectomy, low anterior resection [LAR], abdominoperineal resection [APR], appendectomy). Our primary outcomes were: (a) the count / fraction of total annual published literature, clinical trials (including randomly controlled trials), and reviews (including meta-analyses and systematic reviews) focused on the description or analysis of minimally invasive approaches, further split by laparoscopic versus robotic qualifiers; and (b) the time (in years) to the fraction of minimally invasive articles reaching 50% of the total.
Results: Among the 8 categories and 30 procedures, biliary, foregut, and obesity surgeries had the highest and quickest rate of adoption of minimally invasive techniques. At its peak, 67.5% of cholecystectomy articles published in a single year (1997) described or mentioned laparoscopic approaches, as did 72.0% of articles about Nissen fundoplication (2002). Solid organ and thoracic procedures appear to lag behind; at its peak, only 15.3% of articles in 2020 relating to hepatic resection included or mentioned laparoscopic approaches; adrenalectomies had the largest fraction of all solid organ procedures at 37.8% (in 2011). Similarly, at its zenith, only 4.3% of articles about pulmonary wedge resections in 2014 included, in part, laparoscopic approaches, as did only 12.4% of the esophagectomy literature (2012). Hernia repair and colorectal procedures were more evenly split with, roughly half the literature describing or relating to minimally invasive techniques at their peak.
More globally, we noticed two general trends to adoption of minimally invasive approaches: (a) either a quick inflection point in which virtually all the literature appears to switch focus overnight (e.g. cholecystectomy), or (b) a more linear/slow rise as observed with solid organ or thoracic surgeries (e.g. adrenalectomy). Quantitatively: In 1989, 2.3% of cholecystectomy literature described or analyzed laparoscopic approaches, when contrasted to only 3 years later (1992), when the fraction jumped to 51.9% of all articles. In comparison, the adoption of laparoscopic approaches in the adrenalectomy literature was linear, increasing from 5.8% in 1993 to 30.3% in 2003, at a rate of 2.5% per year for that decade.
Conclusion: Understanding the trends in literature as a proxy for integration of minimally invasive techniques into surgical practice is the first step to illuminating the hurdles for adoption of surgical innovation (including minimally invasive and robotic approaches). As we have shown, adoption of minimally invasive techniques can be classified into two broad categories. Interrogating the factors that drive these differences in adoption profiles will shed insight into how best to develop and promote future surgical innovations.
Bariatrics—laparoscopic
P001—Predictors of diabetes remission after bariatric surgery: a systematic review and meta-analysis
Ashutosh Gumber1, G. Kumar2, A. Aspari3, V. Ramesh4, S. Sangara Narayanan5
1NHS Lanarkshire, Colorectal surgery, 2Royal Bolton Hospital, General surgery, 3Southend University Hospital, Colorectal surgery, 4Broomfield Hospital, Colorectal Surgery, 5Queens Hospital Burton, Colorectal Surgery, United Kingdom
Introduction: Recent report of International Diabetes Federation reported that around 463 million (9.3%) of adults (aged between 20 to 70 years) have diabetes globally. It had also projected the future number to be from 578 million (10.2%) to 700 million (10.9%) by the year 2030 and 2045 respectively. Bariatric surgery has been implicated as a practical therapeutic approach to cure Type 2 Diabetes Mellitus. Hence, the present study aims to analyse the factors that can predict type2 diabetes remission after bariatric surgery and to update the recent literature information by this systematic review.
Methods: Search strategy followed PICOS framework and PRISMA standards. PubMed, EMBASE, Cochrane Library, MEDLINE, and CINAHL databases were searched. SPSS version 19 and RevMan 5.0 software were utilised for statistical analysis.
Result: Five articles were eligible for inclusion from 2010 to November 2019. Characteristics of the study are shown in Table 1. The mean age of the population in the remission group was younger (40.24 years) than the non-remission groups (p < 0.02). Statistically, a significant difference was also found with mean HbA1c in the remission group (7.78%) than the non-remission group (8.96%). Mean BMI and duration of DM were different in two groups, but statistical significance was not observed. Baseline characteristics of the participants are shown in Table 2.
Table 1.
Charateristics of the included sudied

Table 2.
Baseline characteristic of the patricipants

Conclusion: ABCD (Age, BMI, C-peptide and duration of type 2 DM) score has been widely used over the years for defining remission in type 2 DM following bariatric surgery. The current analysis statistically identified advanced age and HbA1c levels as an influential factor for non-remission. Though the difference in BMI and duration of DM noticed in two groups, it was not statistically significant. Our analysis is in agreement and the continuation of the review by Wang et al. (2015). He concluded that younger age group, shorter duration of type 2 DM and adequate glycemic control were responsible for remission after bariatric surgery.
Bariatrics—laparoscopic
P005—The Impact of using PTFE made band in Laparoscopic sleeve gastrectomy on the short and mid term outcomes of weight loss, prospective cohort study
Sherif Albalkiny
Aneurin Bevan Heath Board, General surgery, United Kingdom
Background: The two-stage procedure, Laparoscopic bilio-pancreatic diversion duodenal switch (BPD-DS), was the original precursor for laparoscopic sleeve gastrectomy (LSG). Nowadays, sleeve gastrectomy become the most popular and commonly performed bariatric procedure in the world. Low satisfactory long term outcome of the LSG is also increasing, particularly; maintenance of long-term weight loss is a major concern. Aetiology for insufficient weight loss or weight regain is multifactorial; an increase in the gastric reservoir size due to long-term gastric pouch dilation is frequently suggested to be one of the main causes. Following the same concept of applying a band on the gastric pouch in LRYGB, banded LSG might come out with similar satisfactory long-term outcome.
Patient and Methods: Prospective study included 99 patients who underwent Laparoscopic sleeve gastrectomy, between January 2015 and January 2018 at Ain Shams University Hospitals. Patients are divided into two groups, Group I (N = 50) underwent Traditional laparoscopic sleeve gastrectomy (LSG) and Group II (N = 49) underwent Laparoscopic Banded sleeve gastrectomy (LBSG). Follow up of percentage of excess weight loss (% of EWL) which was our primary outcome. Moreover, assessments of the degree of improvement of preoperative comorbidities, weight gain as well as detection of postoperative complication whether early or late.
Results: Of 99 patients, 80 patients (81%) had completed one year, 68 patients (69%) had completed 2 years, and 60 patients (60%) had completed 3 years of follow-up. Percentage of EWL. In the LBSG group was higher than in the LSG group and had a statistically significant difference at each given time point after one and three years. The LBSG group had less weight regain (2%) at the 3-year follow-up visit compared to LSG group (16%) (P = 0.015).
Conclusion: LBSG is superior to LSG in promoting and maintaining mid-term weight loss without adding extra burden in terms of operative time and post-operative complications.
Bariatrics—laparoscopic
P006—Influence of the gastric stump's volume on the long-term results of laparoscopic Roux-en-Y gastric bypass surgery: 3-year observation data
Aleksandr Khitaryan, D. Melnikov, A. Orekhov, A. Mezhunts, S. Adizov, A. Abovyan, C. Amegninou
Clinical Hospital «Russian Railway-Medicine» Rostov-on-Don», Surgical, Russia
Objective: was to retrospectively analyze the dependence of long-term results of laparoscopic Roux-en-Y gastric bypass surgery according to size of the formed gastric stump.
Methods and materials: Were studied the outcomes of 207 morbid obese patients who underwent laparoscopic Roux-en-Y gastric bypass surgery by two different techniques. The median follow-up of 36 months. Two groups of patients were identified according to the method of formation of the gastric stump: using 2 (1st group) or 3 (2nd group) stapler cassettes and performing of computed tomography volumetry to determine the volume of the created gastric stump.
Results: The average volume of gastric stump was 23.8 ml (8.9–37.3 ml) in the 1st group and 47.7 ml (31.9–72.8 ml) in the 2nd group (p < 0.0001). Relapse of weight gain or insufficient weight loss (loss of < 70% overweight) at median follow-up of 36 months were observed in 2 (2.3%) and 12 (9.9%) cases in groups 1st and 2nd, respectively (p < 0.05).
Conclusion: It was revealed that the formation of the stomach of a very small volume by 2 stapler cassettes compared to using 3 stapler cassettes contributes to improving the results in the postoperative period and minimizes the frequency of relapse of weight gain and insufficient weight loss. The restrictive component of the surgery with equal malabsorbent is fundamental. Based on computed tomography volumetry, the volume of a small-sized stomach stump can be reliably measured and, accordingly, weight loss is predicted in the long term after the surgery, as well as the absence of relapses of weight gain or insufficient weight loss.
Bariatrics—laparoscopic
P007—Minimally invasive subtotal gastric resection for refractory gastroparesis
Vasil Kyosev, P.G. Ivanov, V.M. Mutafchijski, G.K. Kotashev, K.S. Vasilev, G.B. Grigorov, D.K .Penchev, M.B. Gavrilov
Millitary Medical Academy, Endoscopic surgery, Bulgaria
Introduction: Gastroparesis is a functional disorder resulting in debilitating nausea, esophageal reflux, and abdominal pain and is frequently refractory to medical treatment. Therapies such as laparoscopic pyloroplasty and neurostimulators can improve symptoms. When medical treatment and relieving surgery fail, palliative subtotal gastric resection with minimally invasive approach is an option for the patients.
Aim: We examined outcomes after minimally invasive surgery (MIS) presenting with subtotal gastric resection for postoperative gastroparesis.
Materials and methods: From February 2018 until March 2019 in our unit three consecutive patients with postoperative gastroparesis (GP) underwent minimally invasive subtotal gastric resection. Data recorded included demographic information, body mass index (BMI), estimated blood loss (EBL), length of surgery, length of hospital stay, and rate of complications. Secondary outcomes were improvements in pre- versus postoperative symptoms at last follow-up, measured on a five-point scale.
Results: A total of three patients were identified. They underwent MIS subtotal gastric resection with Roux-en-Y reconstruction during the study period. The mean age was 53.8 years with a mean BMI of 24.3 ± 3.2, a mean ASA score of 2.75 ± 0.25 and etiology of GP was similar. All patients have previous relieving surgery for GP (Laparoscopic pyloroplasty with or without vagotomy). Mean operative time was 190 ± 26 min, with a median EBL of 180 ml. There were no conversions to laparotomy and no mortalities, median length of stay was 9 days. One patient suffered a leak, treated conservatively. With a median follow-up of 12 months, nausea improved or resolved in 90%. Chronic abdominal pain improved or resolved in 80%. Belching and bloating resolved for 90%, respectively (p < 0.01).
Discussion: Postoperative GP, particularly is a relatively new diagnosis. Therapy begins with dietary and lifestyle modification, usually combined with medical therapy, to manage their chronic symptoms to enable them to have a reasonable quality of life and to keep them out of the emergency room. Symptoms of gastroparesis can often mimic or cause a multitude of other foregut symptoms, with underlying cause—poor gastric emptying. When patients fail all attempts to pharmacologically or surgically manage their symptoms, a MIS subtotal gastric resection will give good symptomatic outcomes and ameliorate their quality of life.
Conclusions: Regardless of etiology, medically refractory gastroparesis can be a devastating disease. MIS subtotal gastric resection can ameliorate or relieve nausea, belching, bloating and chronic abdominal pain. Surgical removal of the diseased end organ is an effective treatment of gastroparesis.
Keywords: Refractory – Gastroparesis – Gastric resection – Gastric surgery.
Bariatrics—laparoscopic
P008—Slipped LINX® caused by a short esophagus or an intra-thoracic sleeve migration (ITSM) or the combination of both?
Dietmar Pixner, F. Granderath, A.Niyaz, G. Safi, T. Wiesenberg, M. Schkensak
KH Neuwerk Maria von den Aposteln, Allgemein- und Viszeralchirurgie, Germany
Indroduction: This is a case report of a postbariatric surgery complication after laparoscopic sleeve gastrectomy (LSG) with post-operative de novo GERD. The patient underwent a magnetic sphincter augmentation with the use of a LINX®-system. Due to intrathoracic slipping of the Linx® device, we performed an explantation of the Linx® and 3 months later, to complete the anti-reflux procedure, a re-do to sleeved Roux-en-Y-bypass.
Discussion: After LSG the surgical options to treat the de novo GERD symptoms since the gastric fundus to perform a fundoplication is no longer an option. The only solution to manage severe reflux after laparoscopic sleeve gastrectomy (LSG) was converting to Roux-en-Y-gastric bypass (RYGB). The guidelines for the management of hiatal hernia recommend: During operations for Roux-en-Y gastric bypass, sleeve gastrectomy, and the placement of adjust-able gastric bands, all detected hiatal hernias should be repaired. Therefore we repaired the hiatal hernia with 2 nonabsorbable suture posteriorly, even primary sutured crural repair has a very high recurrence rate. The percentage of hiatal hernia recurrence after primary repair has been described to be up to 42%. A reinforced repair with MESH according the hiatal surface area was due to size of the hernia not indicated. Corresponding the guidelines for the management of hiatal hernia for the appearance of a short esophagus: A necessary step of hiatal hernia repair is to return the gastroesophageal junction to an infradiaphragmatic position was made. A minimally invasive approach has been proposed in patients with GERD and hypotensive LES: the LINX® Reflux Management System. Laparoscopic placement of the LINX® system to treat severe reflux after sleeve gastrectomy is a safe alternative procedure to conversion to a RYGB.
Conclusions: Developing a de novo GERD post LSG is still a case of debate, fact is that the options to treat this issue are limited. The widely performed and mostly accepted procedure among bariatric surgeons is the conversion from a high pressure system LSG, to a low pressure system Roux- en Y gastric bypass. In our case we proved that the sphinkter augmuntation using a Linx- devise was for the first 6 months effective in treating the symptoms of GERD. Later on due to the presence of a short esophagus which caused the migration of the Band intra- thoracically, the patient developed recurrent symptoms. We suggest using this alternate treatment for de novo reflux post LSG in patients with small hiatal hernia without slippage of the gastric sleeve intra- thoracically, as this may, implicate the presence of a short esophagus, which was the case for us.
Bariatrics—laparoscopic
P009—Management of choledocholithiasis in patients with gastric bypass surgery in a 2nd level center in Spain
Alexander Leonel Osorio Ramos1, M.G. Guell1, R.F. Farré1, R.D. Diaz1, S.R. Sanchez1, L.S. Sanchón2, C.G. Guariglia2, S.P. Pardo2
Althaia, 1Cirugía esofagogástrica, 2Cirugía General, Spain
Objetive: We present 3 cases of laparoscopy-assisted endoscopic retrograde cholangiopancreatography (ERCP) in patients with choledocholithiasis after gastric bypass surgery as a therapeutic option in a 2nd level center in Barcelona, Spain.
Methods: There is 0.2%–5.3% risk of choledocholithiasis after bariatric surgery and ERCP may be necessary in patients with gastric bypass, but access to the bile duct is challenging due to the distance to be covered by the endoscope.
Aside from ERCP, interventional options to access the biliary tree include laparoscopic or open common bile duct exploration, percutaneous transhepatic instrumentation, transgastric or transenteric ERCP, and ERCP with special endoscopes.
The transgastric approach has a 98% success rate and allows for direct antegrade access to the biliary tree, but it requires the ERCP to be performed in the supine, which may be a challenge for the endoscopist.
The recommendation is a timely coordinated approach between surgeon, gastroenterologist, and radiologist.
The available experience and patient acuity are the primary factors that should guide the approach to treatment.
Results: 58-year-old woman,gastric bypass was performed in 2013, was admitted due to pain and cholestasis. Ultrasound(US): dilation of the intrahepatic bile duct. MRI:cholelitiasis and choledocholithiasis.
Patient 2.
48-year-old woman, gastric bypass performed in 2015, was admited due to liver colic, normal laboratory tests,US and MRI:Cholelitiasis and dilatation of choledoc fins to distal level without visualize the cause.
Patiente 3.
52-year-old woman,gastric bypass was performed on 03/13/2020, was admitted due to lithiasic pancreatitis. US and MRI:Lithiasis lane at the level of the distal common bile duct, without bile duct dilation.
Transgastric ERCP + laparoscopic cholecystectomy was performed in the 3 cases, without complications, they were discharged after 3–4 days.
Conclusions: Low prevalent disease.
Experiences published with short series.
The surgical option allows a cholecystectomy to be performed at the same time.
Accessible equipment and instruments in most centers.
Standard laparoscopic skills.
In cholecystectomized patients we consider Transgastric ERCP to be the first treatment option.
Bariatrics—laparoscopic
P010—Diagnosis and treatment persisted presentations of GERD following bariatric surgery due to hiatal hernia related-2 cases report
Chen Sheng Shih
Kaohsiung Veterans General Hospital, general and bariatric surgery, Taiwan
Bariatric surgery y alters the normal stomach anatomy resulting in a significant incidence of hiatal hernia and gastroesophageal reflux disease.Majority of patients remain asymptomatic, or could be treated with PPI or eating behavior correction.Minimal parts of patient persisted complained of severe heartburn refractory to medical management. Here, we describe the diagnosis and treatment regarding two cases of following bariatric surgery with peristed presenting with heat burn, chest pain or hiccup.Routine workup failed to diagnosis clear mechanical cause of these symptoms. Patient was still refractory to PPI treatment. We use of multidetector CT and upper gastrointestinal contrast studies eventually revealed the diagnosis of hiatal hernia.Abdominal CT showed staple line sliding into chest.When diagnosis was made. Laparoscopic hiatal hernia repair was done via crus muscle suture with 38 French OG tube in the esophagus.And bio-made mesh was fixed to diaphragm and orifice of crus mucle. When patients follwed up at OPD, GERD improved.
Bariatrics—laparoscopic
P011—One-year outcomes assessment of laparoscopic sleeve gastrectomy with Bariatric Analysis and Reporting Outcome System in the new set bariatric centre
Mateusz Wityk1, J. Feszak1, W Makarewicz2, C. Kaczmarkiewicz1, M. Bobowicz2
1Voivodeship Specialist Hospital of Janusz Korczak, Department of General and Oncological Surgery, 2Medical University of Gdansk, Department of Oncological Surgery, Poland
The aim of the study was to assess one-year outcomes of Laparoscopic Sleeve Gastrectomy (LSG) in the newly created bariatric centre in Poland. Twelve months after surgery percent of excessive body mass index loss (%EBMIL), comorbidities resolution in combination with the quality of life (QoL) were checked. BAROS system was used for results evaluation. Surgical success was deemed with %EBMIL > 50% and very good or excellent final BAROS score. Statistical significance was assumed at p ≥ 0.05. 57 of 64 patients, 18 men with mean age of 39.7y (19–55), BMI 46.14 kg/m2 (36.6–55.51) and 39 women with mean age of 41.2y (22–65), BMI 44.83 kg/m2 (36.57–65.96) were involved in this study. 7 patients were lost to the follow-up due to withdrawal of consent. Mean %EBMIL was 78.8% (20.3–134.7) and only 3 patients achieved %EBMIL < 50%0.70.2% of 57 patients had comorbidities before surgery. Diabetes improved in 33.3% and resolved in 50%; hypertension improved in 46.4% and resolved in 35.7%, osteoarthritis improved in 20% and resolved in 80%, dyslipidaemia and sleep apnoea both resolved in 100%. Final BAROS score was fair in 1.8%, good in 12.3%, very good in 40.4%, excellent in 45.6%. There was no mortality. Two complications with Clavien-Dindo grade I and IIIb occurred. LSG seems to be proper surgical option for well-matched obese patients and good results of weight loss, comorbidities resolution and QoL can be achieved even in newly set bariatric centres.
Bariatrics—laparoscopic
P012—Complete staple line reinforcement during laparoscopic sleeve gastrectomy reduces postoperative morbidity: a propensity score matched analysis
Panagiotis Lainas1, C.Dammaro1, J. Derienne1, M. Safieddine3, R. Kassir4, G. Perlemuter2, I. Dagher1
Antoine-Beclere Hospital, 1Department of Minimally Invasive Digestive Surgery, 2Department of Gastroenterology, CHU Felix-Guyon, 3Methodological Support Unit, 4Department of Digestive and Bariatric Surgery, St-Denis, La Reunion, France
Aim: Two feared complications of laparoscopic sleeve gastrectomy (LSG) are bleeding and staple line leak. Both can lead to significant morbidity, and even death. Therefore, any technique reducing the likelihood of these complications would be of tremendous benefit. Our aim was to evaluate safety and efficacy of complete staple line buttressing coupled to perioperative arterial hypertension control to minimize perioperative complications in severely obese patients undergoing LSG.
Methods: Data from consecutive patients who underwent LSG in our department between 2010 and 2019 were prospectively collected and retrospectively analyzed. Patients were divided into two groups: i) complete staple line buttressing and use of perioperative arterial control hypertension protocol (systolic pressure < 140 mmHg intraoperatively and postoperatively); ii) complete absence of buttressing and no perioperative arterial hypertension control. Data of interest were patients’ characteristics, intraoperative results, postoperative course and follow-up data. Propensity score adjustment was performed on the factors known to influence postoperative complications after LSG.
Results: 439 patients were matched in each group. Mean age was 41.7 and 40.7 years for buttressing and non-buttressing groups, respectively. Mean BMI was 42.5 kg/m2 for buttressing group versus 42.2 kg/m2 for non-buttressing group. Mean operative time was significantly reduced when buttressing was used (84 min versus 104 min for non-buttressing; p < 0.001). Mean blood loss was similar, despite the presence of a more hemorrhagic staple line when buttressing was not used. Postoperative hemorrhage or hematoma was noted in 17 patients in the non-buttressing group versus none in buttressing group (p < 0.001). No statistically significant difference was noted for staple line leak between the two groups, with 6 patients (1.4%) developing staple line leak in the buttressing group versus 15 (3.4%) in the non-buttressing group (p = 0.07). Reoperation was required for two patients (0.4%) in the buttressing group versus 24 patients (5.5%) in the non-buttressing group (p < 0.001). Mean weight loss at one year was similar between the two groups (p = 0.26).
Conclusions: The use of staple line buttressing coupled to perioperative arterial hypertension control leads to significant reduction of bleeding and reoperation rates, as well as non-significant reduction of staple line leak rates in severely obese patients undergoing LSG.
Bariatrics—laparoscopic
P013—Is it possible to assess weight loss after bariatric surgery?—validation of available predictive models
Izabela Karpińska, M. Wierdak, M. Pędziwiatr, P. Major
Jagiellonian University Medical College, 2nd Department of General Surgery, Poland
Aims: Bariatric surgery is proven to be the most effective treatment of obesity. However, the extent of weight loss varies considerably among patients and not all of them achieve desired outcome after surgical intervention. Effort has been made to identify predictive factors of weight loss after bariatric surgery resulting in various individualized prediction models proposed to optimize presurgical assessment of patients and facilitate follow-up evaluations. We aimed to validate the performance of available risk prediction models for body weight reduction 1 year after surgical treatment.
Methods: The retrospective analysis included consecutive patients with T2DM who underwent Roux-en-Y gastric bypass (RYGB) or sleeve gastrectomy (SG) between 2009 and 2017 in a single tertiary referral center and completed 1-year follow-up. Weight loss predicted by 12 different models were calculated for each patient. The correlation between predicted and actual weight loss was assessed using linear regression. Accuracy of each model was evaluated by squared Pearson’s correlation coefficient (R2). Goodness-of-fit was assessed by standard error of estimate (SE) and paired sample t test between estimated and observed BMI.
Results: Out of 760 patients enrolled 509 (67.00%) were women with median age 42 years. 65.92% of patients underwent SG and 34.08% had RYGB. Median BMI decreased from 45.19 kg/m2 to 32.53 kg/m2 after 1 year. EWL amounted to 62.97%.
All models presented significant relationship with weight loss in linear regression analysis (correlation coefficient between 0.29 and 1.22). The best predictive model explained 24% variation of weight reduction (adjusted R2 = 0.24). Majority of models overestimated the outcome with SE varied from 5.03 kg/m2 to 5.13 kg/m2.
Conclusions: Although BMI predicted by all models had reasonable correlation with values observed after bariatric surgery, none of them presented acceptable accuracy. All tools tend to overestimate the outcome. Accurate tool for weight loss prediction should be developed to enhance patients assessment and define realistic expectations.
Bariatrics—laparoscopic
P014—Laparoscopic sleeve gastrectomy with omentopexy: is it really promising method?
A systematic review with meta-analysis
Piotr Zarzycki, P. Małczak, M. Rubinkiewicz, M. Wierdak, J. Kulawik, P. Major
University Hospital in Krakow, Department of General, Oncological, Metabolic and Emergency Surgery, Poland
Introduction: Laparoscopic sleeve gastrectomy (LSG) is one of the most common bariatric procedures around the world. Omentopexy is a novel technique performed during LSG. There is no clear conclusions of indications for this procedure, safetyness and effects of such a method.
Aim: To compare the outcomes of laparoscopic sleeve gastrectomy (LSG) with omentopexy (OP) and without omentopexy.
Methods: We searched the Medline, EMBASE, and Scopus databases in June 2020. Full text articles and conference abstracts were included for further analysis. This review follows the PRISMA guidelines.
Results: From 66 articles, 4 studies (N = 1396 patients) were included in the meta-analysis. One randomized trial. Our findings showed that LSG with omentopexy had significantly lowered overall morbidity compared to LSG without omentopexy (MD = 0.38; 95% CI [0.15, 0.94]; P = 0.04) (Fig. 1). Gastric leakage rate (MD = 0.17; 95% CI [0.04, 0.76]; p = 0.02) was also significantly lower in group of LSG with omentopexy (Fig. 2). In length of stay, there were no significant differences between groups.
Conclusions: Our meta-analysis showed that LSG with omentopexy can be a feasible procedure for decreasing morbidity and gastric leaks rate. However, despite promising results, still lack of well quality studies. There is substantial need for more studies, mainly for large randomized controlled studies.

Bariatrics—laparoscopic
P016—Comparison of Bioelectrical Impedance Analysis and Computed Tomography on Body Composition Changes after Bariatric Surgery in Asian Patients with Obesity
Ja Kyung Lee, Y.S. Park, T.J. Oh, W. Jang
Seoul National University Bundang Hospital, General Surgery, Korea
Purpose: The accuracy of bioelectrical impedance analysis (BIA) in patients with obesity has been controversial. This study aimed to validate the use of BIA in detecting body composition changes, especially for visceral fat, before and after bariatric surgery using computed tomography (CT) as a reference method.
Materials and Methods: This retrospective study included Korean patients with a BMI of ≥ 35, or ≥ 30 with metabolic comorbidities. All patients underwent bariatric surgery, and underwent BIA and CT evaluation before and six months after the operation. The skeletal muscle index (SMI) and visceral fat index (VFI), variables corrected for height, were compared between BIA and CT.
Results: Forty-eight patients (18 men, 30 women) demonstrated a mean weight loss of 27.5 kg. Significant decreases in both VFI and SMI were observed in both BIA and CT (all p < 0.001), with greater VFI change compared to SMI (48.2% vs. 10.4% in CT, respectively). Both pre- and post-operative measurements of VFI and SMI were significantly correlated between BIA and CT (all p < 0.05). However, the percent decrease was significantly correlated only with VFI (ρ = 0.71, p < 0.001). The Bland–Altman analysis showed that BIA underestimated VFI, with a greater degree of underestimation in subjects with higher VFI.
Conclusion: Despite the underestimation of BIA in measuring visceral fat, BIA VFI was associated with CT VFI. The SMI values showed significant correlations before and after surgery, but not with the percent decrease. Our results suggest that BIA can be a reliable tool for measuring body composition, especially for visceral fat, after bariatric surgery.
Bariatrics—laparoscopic
P017—Effectiveness of intraperitoneal administration of local anesthetic in laparoscopic bariatric surgery: systematic review and meta-analysis
Yegor Tryliskyy1, I. Demykhova2, A. Kebkalo3, V. Tiselskiy3, D. Pournaras1
1North Bristol Trust, NHS, Division of Gastrointestinal Surgery, 2University of South Wales, Health Sciences, 3Shypuk National Medical Academy of Postgraduate Education, Surgery, United Kingdom
Introduction: Postoperative pain therapy in bariatric surgery remains controversial. The aim of this systematic review and meta-analysis was to compare effectiveness of intraperitoneal administration of local anaesthetic agents (I-LA) with placebo in adults undergoing bariatric surgery.
Methods: Study protocol was registered with PROSPERO (CRD42020216239). A systematic literature searches of EMBASE, MEDLINE, PubMed, CINAHL were conducted according to the Preferred Reporting Items for Systematic Reviews and Meta-Analysis guidelines using predefined terms to identify randomized controlled trial (RCTs) comparing I-LA versus placebo in patients undergoing bariatric surgery. Outcomes were pain scores postoperatively and 24 h morphine equivalent consumption. Random effects modelling to summarize statistics was performed using Review Manager 5.3 software. The risk of bias was assessed using Cohrane’s Risk of Bias tool 2.
Results: Six RCTs with 613 adult participants were included in the analysis. I-LA provided better pain control compared to placebo at 6 h postoperatively (MD -0.76 [-1.33; -0.19], I2 = 88%). There was no difference in severity of pain at 2, 4, 12 and 24 h after surgery between two groups. The level of opioid consumption was significantly lower in the I-LA group (MD -3.70 [-5.83; -1.57], I2 = 60%).
Conclusions: I-LA provides better pain control after laparoscopic bariatric surgery in comparison with placebo at 6 h postoperatively as well as I-LA is associated with lesser opioid consumption. Futher studies are needed to compare I-LA with other opiod-sparing analgesic perioperative modalities.
Bariatrics—laparoscopic
P018—Laparoscopic sleeve gastrectomy is an efficient revisional procedure for patients with a failed gastric plication: a retrospective analysis
Islam El-Sayes, T. Abdelbaki, M. Elkeleny, M. Sharaan
Faculty of Medicine, Alexandria University, General Surgery Department, Egypt
Aim: to analyze weight loss outcome after revision of failed laparoscopic greater curve plication (LGCP) into laparoscopic sleeve gastrectomy (LSG).
Methods: Patients who experienced failure (insufficient weight loss/weight regain) after LGCP performed in our center from 2009 to 2012 were included. LSG was performed for all patients.
Results: Among 127 who underwent LGCP, 42 patients (33%) underwent revision. Mean body mass index (BMI) at time of LGCP was 44 – 6 kg/m2. The highest % total weight loss (%TWL) after LGCP ranged from 11 to 34% (24.1 – 5) (corresponding to % excess weight loss [%EWL] of 12%–47% [33.5 – 12]). The time interval between LGCP and LSG ranged from 12 to 25 months (15.4 – 3.8). After conversion, 2 patients (5%) experienced acute leakage managed by endoscopic stenting. After LSG, mean BMI (kg/m2) was 38, 32, 30, 28, 29, 30.2, and 30.4, while mean %TWL reached 9%, 19%, 24%, 29%, 25%, 25%, and 24% and mean %EWL reached 15%, 51%, 69%, 77%, 68%, 66%, and 64% at 1 month, 6 months, 1, 2, 3, 4, and 5 years, respectively. Except for results at 1 month, all results showed statistical significance (P £ 0.05). After LSG, the incidence of diabetes mellitus and hypertension dropped from 15 (35%) and 13 (30%) to 2 (5%) and 3 (7%) patients, respectively. No follow-up data (0%) were missed.
Conclusion: LSG after failed LGCP has promising weight loss outcomes.
Bariatrics—laparoscopic
P019—Utility of N-butyl-2-cyanoacrilate at gastric sleeve to reforce the suture. a new application
Antonio Gila Bohórques, Pablo de la Herranz Guerrero, J.M. Suárez Grau, J .Gómez Menchero, P. de la Herranz Guerrero, J.L. Guerrero Ramírez
General Hospital of Minas de Riotinto, Department of Surgery, Spain
Introduction: Obesity is considered the great pandemic of the twenty-first century, understood in the so-called metabolic syndrome in which four important factors converge: hypertension, diabetes mellitus, obstructive sleep apnea syndrome and dyslipidemia. It is an important social problem in which conservative measures have failed up to 10% with an increasing rise in associated comorbidities.
Many publications have been developed about the role of surgery in the face of such conservative medical failure, leading to a resolution estimated in more than 80% of cases.
Multiple techniques devised, although, after reaching the maximum exponent as the gold standard of the gastric bypass, due to important comorbidities and the irreversibility of the process, it is the vertical laparoscopic gastrectomy (gastric sleeve), which now determines its position.
The two most widely performed techniques by the different groups of Bariatric Surgery worldwide are Gastric Bypass and Laparoscopic Vertical Gastrectomy (GVL). Both have proved to be effective in the treatment of obesity and its comorbidities. In the GVL, due to the technique in which the gastric structure is tubulized by a stapling line, the reinforcement of this line is recommended because it prevents bleeding and can reduce dehiscence, this being the central theme of our communication; said reinforcement can be performed by continuous monofilament suture, epiploplasty, biological or synthetic protectors of the staple line or biological adhesives n-butyl-2-cyanoacrylate, an adhesive widely used in hernia repair once the prosthetic material (mesh) is implanted, thus creating an effective fixation to the tissues without the need to injure it by other procedures. In the case of bariatric surgery, this product has been designed to be used thanks to a 5-mm trocar laparoscopic gun, by means of which we can apply the adhesive directly on the suture generated by the endo-stapler in the section edge explained above in the technique of laparoscopic vertical gastrectomy.
Objectives: Measurement of days of admission and stay in URP, as well as necessary surgical time, intraoperative complications, hospital stay, conversion rate, re-entry less than a month after surgery and statistical analysis of the results and comparison of the results with the results in the literature in patients submitted to GVL with conventional endostapler and bioabsorbible membrane compared to those subjected to GVL with conventional endostapler and n-butyl-2-cyanocrylate.
Material and Methods: We show the preliminary results of a randomized prospective study of cases and controls in which they compared 19 GVL controls with conventional endostapler and bioabsorbible membrane with 19 cases submitted to GVL with conventional endostapler and n-butyl-2-cyanocrylate.
Results: Once the statistical analysis was applied for each of the variables, in the short-term preliminary results (intraoperative evaluation and post-operative evolution at one month), there was no statistical significance in any of them (p < 0.05).
Conclusions: Given these findings, we can conclude that there is no statistically significant difference between both groups in relation to the previously mentioned variables, although the study aims to extend the time of post-operative evaluation to measure the long-term evolution of these patients.
Bariatrics—laparoscopic
P020—Safety of extended venous thromboembolic prophylaxis with rivaroxaban after bariatric surgery
Volodymyr Tyselskyi1, V.Poylin2, Y. Tryliskyy3, A. Kebkalo1
1Shupyk National Medical Academy of Postgraduate Education, Surgery and Proctology, Ukraine. 2Feinberg School of Medicine, Gastrointestinal Surgery, USA. 3Western Sussex NHS FT, General Surgery, United Kingdom
Aims: Post operative venous thromboembolism (VTE) is common after bariatric surgery and extended post discharge prophylaxis is recommended. Enoxaperin is main agent used, however involves daily injections and is expensive. Rivaroxaban is an oral daily formulation approved for VTE prophylaxis after orthopedic surgery.
The aim of this study is to evaluation of the safety of extended rivaroxaban prophylaxis after bariatric surgery.
Methods: This is a retrospective review of patients who underwent bariatric surgery in Kyiv, Ukraine. Patients received perioperative prophylaxis of VTE with subcutaneous low molecular weight heparin and then switched to rivaroxaban for total of 30 days starting on the 4th postoperative day. Thromboprophylaxis was performed in accordance with the VTE risks derived from the Caprini score (Table 1). On the 3rd, 30th, 60th day after the operation, the patients underwent ultrasound examination of the portal vein and large great vessels, as well as the veins of the lower extremities. Telephone interviews were conducted on the 30th and 60th days after the operation and control examination of the vessels to assess compliance with the regimen and satisfaction with it.
Table 1.
Risk assessment of the possibility of developing venous thromboembolism in patients with morbid obesity on the Caprini score in the postoperative period
| Number of patients, n and % | 38 (49,4%) | 23 (29,9%) | 10 (13%) | 5 (6,4%) | 1 (1,3%) |
|---|---|---|---|---|---|
| Risk of venous thromboembolic complications, points |
6 (high) |
7 (high) |
8 (high) |
9 (very high) |
> 9 (17) (extremely high) |
| Frequency of venous thromboembolic complications, % | 6 | 6 | 6 | 6,0–18,0 | Up to 60 |
Results: Total of 77 patients between July 2019 to December 2020 were included in the study. Average age of patients was 43.6 with average pre operative BMI of 46.5 (from 37 to 75). Seventy four patients (96.1%) had laparoscopic procedure and 3 patients (3.9%) had laparotomy. Sixty one patients underwent sleeve gastrectomy and sixteen patients underwent other procedures including bypass surgery. All patients had a possible probability of thrombotic complications greater than 6%, therefore, received rivaroxaban 10 mg once a day.The average follow-up period for patients was 6 months. There were no symptomatic or radiologic thromboembolic complications in the study cohort. Overall rate of early complications was 6.5% with only 1 (1.3%) patient developing subcutaneous hematoma while taking rivaroxaban (Clavien-Dindo I) (Tables 2.1 and 2.2).
Table 2.1.
Early complications during the first period are not associated with rivaroxaban:
| Complications for Clavien-Dindo | n | % |
|---|---|---|
| Large intra-abdominal hematoma,III a | 1 | 1,3 |
| Insufficient sutures of the stomach, III b | 1 | 1,3 |
| Massive intra-abdominal bleeding, III b | 1 | 1,3 |
| Twist-syndrom, III b | 1 | 1,3 |
| Crash syndrome with acute renal failure, IVa | 1 | 1,3 |
| Total | 5 | 6,5 |
Table 2.2.
Late complications during the first period are associated with rivaroxaban:
| Complications for Clavien-Dindo | n | % |
|---|---|---|
| Subcutaneous hematoma of the anterior abdominal wall, I | 1 | 1,3 |
| Total | 1 | 1,3 |
Conclusion: Extended post operative prophylaxis with rivaroxaban is save and preferred by patients ( patients were satisfied that they did not need to inject) while effective in preventing post bariatric surgery VTE.
Bariatrics—laparoscopic
P021—Conversion to one-anastomosis gastric bypass resolves GERD following sleeve gastrectomy
Maor Staierman, Idan Carmeli, S. Rayman, J. Rachmuth, I. Carmeli, A. Keidar
Assuta public hospital, General surgery, Israel
Introduction:Weight regain and de-novo gastroesophageal reflux disease (GERD) following laparoscopic sleeve gastrectomy (LSG) are common phenomena for which a conversion surgery is often indicated. Of the conversion options available, One-anastomosis gastric bypass (OAGB) is the most common perfomerd primary and revisional bariatric procedure in Israel.
Aim: Evaluate GERD symptoms prior to- and following conversion from LSG to OAGB using patient reported reflux questionnaires.
Methods and subjects:Prospectively collected database of patients undergoing conversion from LSG to OAGB between May 2016 and June 2021.
Data collected included demographics, anthropometrics, pre-conversion esophagogastroduodenoscopy (EGD) and upper gastrointestinal fluoroscopy.
The Diagnostic Questionnaire for Gastroesophageal Reflux Disease (DRQ) and the GERD-Health Related Quality of Life Questionnaire (GERD-HRQL) prior to- and following conversion.
The diagnostic questionnaire responses were compared between prior to- and following the conversion to OAGB.
Results: During the study period 27 patients underwent conversion from LSG to OAGB. Majority of patients (n = 18, 67%) were females.
Indications for conversion were insufficient weight loss (20 patients), GERD ± insufficient weight loss (7 patients) and sleeve stenosis (1 patient).
Mean age at conversion was 46 years (range 20–65) and the mean time between LSG and OAGB conversion was 6.5 years (range 1–14). Mean BMI prior to conversion was 38.4 kg/m2 (range 23.2- 45.5 kg/m2). In 13 patients (48%) there were radiological and/or endoscopic signs of GERD. twelve patients (44%) reported de-novo GERD symptoms following LSG.
DRQ and the GERD-HRQL questionnaires had an initial average score of 37.5 and 20.7 vs. an average post-OAGB conversion of 18 and 10 respectively.
Conclusion:OAGB is an acceptable conversional bariatric procedure for LSG failure for patients suffering from de novo GERD.
Bariatrics—laparoscopic
P022—Pushing the limits in bariatric surgery: laparoscopic sleeve gastrectomy for patients under 18 and over 65 years old with severe obesity
Panagiotis Lainas1, G. De Filippo2, C. Dammaro3, G. Donatelli5, S. Zervaki3, C. Del Basso3, R. Courie4, G. Perlemuter4, I. Dagher3
1Antoine-Beclere Hospital, Saclay University, Department of Minimally Invasive Digestive Surgery, 2Robert-Debre Hospital, Paris, Department of Adolescent Medicine, Antoine-Beclere Hospital, 3Department of Minimally Invasive Digestive Surgery, 4Department of Gastroenterology, Paris, 5Peupliers Private Hospital, Paris, Department of Endoscopy, France
Aims: The prevalence of severe obesity is rising worldwide reaching epidemic proportions, without sparing any age group. The number of pediatric-adolescent and elderly patients with severe obesity is progressively increasing, promoting an important health and financial burden for our societies. Data on obese adolescent patients under 18 years old and elderly patients over 65 years old undergoing laparoscopic sleeve gastrectomy (LSG) are scarce. We aimed to demonstrate that LSG is safe and effective for patients under 18 and over 65 years old with severe obesity. Methods: Prospectively collected data from consecutive patients under 18 and over 65 years old undergoing LSG were retrospectively analyzed. Patients with more than 1-year follow-up were included in the analysis. Quality of life (QoL) was evaluated using the Short-Form 36 questionnaire.
Results: Ninety-eight patients under 18 years old (15–17 years) underwent LSG. Median weight was 130 kg, median body mass index (BMI) 44.2 kg/m2. Median duration of surgery was 71 min. One major complication (severe pneumonia) was recorded, mortality was null. Twelve and 24 months after LSG, median BMI decreased significantly to 29.4 and 28.1 kg/m2, respectively (p < 0.001), with mean percentage of total body weight loss of 29.9% at 2 years. Obesity-related comorbidities and all SF-36 scale scores improved significantly at one year. Seventy-two patients over 65 years old (65–75 years) underwent LSG. Median weight was 122 kg, median BMI 43.5 kg/m2. Median duration of surgery was 84 min. Two patients (2.8%) suffered a gastric staple-line leak, treated by pure endoscopic internal drainage or relaparoscopy and endoscopy. Mortality was null. Twelve and 24 months after LSG, median BMI decreased significantly to 32.4 and 30.2 kg/m2, respectively (p < 0.001), with mean excess weight loss of 77% at 2 years. Most obesity-related comorbidities improved at 2 years, while 6 of 8 SF-36 scale scores improved significantly at 1 year.
Conclusions: LSG is safe and effective for patients under 18 and over 65 years old, providing significant weight loss, comorbidity resolution and QoL improvement. Pushing the inferior and superior age limits under 18 and over 65 years old requires careful patient selection after adequate risk versus benefit evaluation by expert multidisciplinary teams.
Bariatrics—laparoscopic
P023—Conversion From adjustable gastric banding to single anastomosis gastric bypass – long biliopancreatic limb is safe and effective
Jacob Rachmuth, N. Ben-Mordechai, I. Carmeli, S. Rayman, Y. Mnouskin, A. Keidar
Assuta Ashdod Medical Center, General surgery, Israel
Aims: Laparoscopic adjustable gastric banding is a bariatric procedure that carries with it a substantial percentage of complications and weight loss failure. Many patients seek revisional surgery that will both alleviate their complains and provide them with a durable weight loss solution. This study's objective is to evaluate the safety and efficacy of revisions from laparoscopic adjustable gastric banding to single anastomosis gastric bypass with a long bypassed biliopancreatic limb.
Methods: Retrospective review of prospectively collected data of all the patients who underwent conversion of LAGB to LSAGB between April 2015 and December 2020.
Results: During the study period, 109 patients underwent conversion from LAGB to LSAGB in our institute (83 females, 26 males). Mean age was 44.1 years (range 19–67), and mean BMI was 44.9 kg/m2 (range 35.9–59.2). Mean length of bypassed bowel was 227 cm (range 200–400). Mean hospital length of stay was 3.1 days. In the immediate post-operative course, there were 7 minor complications (2 respiratory distress, 3 wound infection, 2 bleeding). No leaks or other major complications were observed during hospitalization and in the early follow up period. Mean follow-up period was 18.3 months (range 8–72). Mean percentage of BMI loss was 67.3 (range 40.5–119.4). One patient was converted to LRYGB due to bile reflux. Mean bowel movement per day was 2 (range 1–5). None of the patients suffered from hypoalbuminemia and 2 patients developed iron deficiency anemia, both after discontinuing taking dietary supplements. No other dietary deficiencies were observed.
Conclusion: Conversion from LAGB to LSAGB with a long limb of bypassed bowel is a safe and effective revisional procedure. Close follow-up and assurance of compliance with dietary supplements intake is necessary. Further studies with longer follow up time need to be conducted, in order to evaluate the added benefit of the linger limb and the metabolic results in the long term.
Bariatrics—laparoscopic
P024—Single incision laparoscopic sleeve gastrectomy: lessons learned after 1800 procedures
Panagiotis Lainas1, N. Devaquet2, C. Del Basso2, S. Zervaki2, A. Lebrun3, R. Courie3, C. Voican3, H. Tranchart2, G. Perlemuter3, I. Dagher2
1Antoine-Beclere Hospital, Paris-Saclay University, Department of Minimally Invasive Digestive Surgery, Antoine-Beclere Hospital, Paris, 2Department of Minimally Invasive Digestive Surgery, 3Department of Gastroenterology, France
Aims: Single incision laparoscopic sleeve gastrectomy (SILSG) is performed routinely in our department as an alternative to the conventional laparoscopic approach used by many teams worldwide. Data on patients undergoing SILSG for severe obesity are scarce in the literature. The aim of this study was to evaluate the mid-term clinical outcomes of SILSG in a large series of patients undergoing SlLSG as a stand-alone procedure.
Methods: Data from 1800 consecutive patients who underwent SILSG between 2010 and 2017 were prospectively collected and retrospectively analyzed. Patients with more than 1-year follow-up were analyzed in terms of weight loss and comorbidities resolution.
Results: Mean age was 42.3 years. Median BMI was 45.3 kg/m2 (range: 33.8–84.6 kg/m2). Median operative time was 88 min. An additional port was required in 89 patients (4.9%). Postoperative mortality and total morbidity rates were 0.05% and 7.5%, respectively. Relaparoscopy and/or endoscopic treatment were required for intra-abdominal bleeding in 27 patients (1.5%) and staple-line leakage in 35 patients (1.9%). Mean excess weight loss (EWL) was 71.1%, 73.7% and 70.4% at 1, 2 and 4 years after SISG, respectively. Two years after SILSG, sustained statistical significant remission of type 2 diabetes, arterial hypertension, obstructive sleep apnea syndrome and gastroesophageal reflux disease was noted in 73.2%, 63.1%, 72.6%, and 49.3% of patients, respectively. Incisional hernia occurred in 39 patients (2.1%).
Conclusions: SILSG can be routinely performed with good and sustained midterm EWL results and comorbidities resolution. To our knowledge, this is the largest report worldwide on patients undergoing SILSG for the treatment of severe obesity.
Bariatrics—laparoscopic
P025—Roux-en-Y gastric bypass as a treatment for Barrett’s esophagus after sleeve gastrectomy
Daniel Moritz Felsenreich, J.J. Julia, L.G. Lisa, J.E. Jakob, I.K. Ivan, F.L. Felix, G.P. Gerhard
Vienna Medical University, Department of Surgery, Austria
Background: Laparoscopic sleeve gastrectomy (SG) is the most frequently performed bariatric procedure today. While an increasing number of long-term studies report the occurrence of Barrett’s esophagus (BE) after SG, its treatment has not been studied, yet.
Objectives: The aim of this study was to evaluate Roux-en-Y gastric bypass (RYGB) as treatment for BE and reflux after SG.
Setting: University hospital setting, Austria.
Methods: This multi-center study includes all patients (n = 10) that were converted to RYGB due to BE after SG in Austria. The mean interval between SG and RYGB was 42.7 months. The follow-up after RYGB in this study was 33.4 months. Gastroscopy, 24 h pH-metry, and manometry were performed and patients were asked to complete the BAROS and GIQLI questionnaires.
Results: Weight and BMI at the time of SG was 120.8 kg and 45.1 kg/m2. Eight patients (80.0%) went into remission of BE after the conversion to RYGB. Two patients had RYGB combined with hiatoplasty. The mean acid exposure time in 24 h decreased from 36.8% to 3.8% and the mean DeMeester score from 110.0 to 16.3. Patients scored 5.1 on average in the BAROS after conversion from SG to RYGB which denotes a very good outcome.
Conclusions: RYGB is an effective therapy for patients with BE and reflux after SG. Its outcomes in the current study were BE remission in the majority of cases as well as a decrease in reflux activity. Further studies with larger cohorts are necessary to confirm these findings.
Bariatrics—laparoscopic
P026—To study the impact of bariatric surgery on urinary incontinence in obese individuals
Prasanna Ramana Arumugaswamy, S. Aggarwal, R. Kumar, P. Singh
All India Institute Of Medical Sciences New Delhi, Surgery, India
INTRODUCTION/BACKGROUND: There is sparse evidence about the beneficial effects of bariatric surgery on urinary incontinence.
Aim: To study the impact of bariatric surgery on urinary incontinence in obese individuals.
Methods: Patients undergoing bariatric surgery between June 2018 to June 2019 (n = 148) in our institute were screened using the International Consultation on Incontinence Questionnaire-Urinary Incontinence-Short Form (ICIQ-UI-SF) questionnaire. Those patients found to have urinary incontinence were identified and followed up at 3 month, 6 month and 1 year post surgery and the ICIQ-UI-SF questionnaire was applied at each follow up. Using the questionnaire the patients with urinary incontinence were classified as having stress, urge and mixed type of urinary incontinence. The change in scores and prevalence were compared. Also number of pads changed per day was recorded. In follow up weight loss, comorbidity resolution and improvement were also studied.
Results: (FIGURE 1)
A total of 148 patients underwent bariatric surgery (LSG = 92, MGB = 29, RYGB = 27) between July 2018 and July 2019. 114(77.02%) were females and 34(22.97%) were males. 41patients (27.7%; M = 2, F = 39) had urinary incontinence of which 29 (70.7%) had pure stress incontinence, 8 (19.5%) had pure urge incontinence and 3 (7.3%) had mixed urinary incontinence. Using logistic regression, it was found gender was the most important predictor of having urinary incontinence in obese individuals (odd’s ratio: 8.33; relative risk: 5.79). The prevalence of urinary incontinence decreased from 27.7% at baseline to 21.6% at 3 months (p < 0.001), 8.1% at 6 months (p = 0.008) and 3.4% at 1 year (p < 0.001). The mean ICIQ UI SF score improved from 8.76 (SD = 3.2) at baseline to 4.4 (SD = 5.9) at 3 months, 1.6 (SD = 6.4) at 6 months and 0.66 (SD = 2.1) at 12 months of follow up, p < 0.001 for all follow ups. The proportion of patients with urinary incontinence using any number of pads decreased from 92.7% (n = 38) at baseline to 70.7% (n = 29) at 3 months (p = 0.008), 19.5% (n = 8) at 6 months (p < 0.001) and 9.8% (n = 4) at 12 months (p < 0.001). There was a decrease in the number of patients having moderate to very severe urinary incontinence from 35 (85.4%) at baseline to 11 (26.8%) at 3 month (p = 0.004), 3 (7.3%) at 6 months (p < 0.001) and 2 (4.9%) at 12 months (p < 0.001). Proportion of patients showing resolution was highest among the stress incontinence group at 96.5 percent. Trends of BMI, ICIQ UI score and number of pads used is shown in FIGURE 2.
Presence or absence of diabetes mellitus, hypertension and hypothyroidism did not significantly influence baseline or follow up ICIQ-UI-SF scores. It was noted that higher baseline ICIQ-UI-SF scores meant relatively higher scores at follow up also. Mean percent excess BMI loss was 68.9% at 1 year.
Conclusion: Bariatric surgery leads to definite improvement in urinary incontinence in obese individuals which is well sustained at 1 year follow-up. Patients with stress urinary incontinence derived better outcomes post bariatric surgery (Table).

Table.
.

Bariatrics—laparoscopic
P027—Gastric bypass in treatment morbidly superobese patients
Oleksandr Usenko, O. Tyvonchuk, V. Moskalenko, Y. Voitiv, R. Vinogradov
Shalimov National Institute of Surgery and Transplantology, Toraco-abdominal surgey, Ukraine
Background: Gastric bypass is a group of one of the main operations in treatment patients with obesity. But, due to the lack of a “ideal” operation the search is continues. Trends in modern bariatric surgery is in introduction of single anastomosis operations. One of them mini-gastric bypass (MGB) which was well studied and has a long-term results. Based on these results we proposed our gastric bypass operation.
Methods: MGB by R. Rutledge with 200 cm biliopancreatic loop. Long-limb gastric bypass (LLGB) was performed with big gastric pouch by crossing stomach above antral part and making semi-handed gastrojejunostomy with 200 cm loop long from the ligament of Treitz. All operations were performed laparoscopically. There were 63 patients. In MGB group were 52 patients with average age 43.7 ± 9.5 years; average BMI was 58.2 ± 3.1 kg2. In LLGB group were 11 patients with average age 42.8 ± 7.4 years and BMI 58 ± 2.1 kg2.
Results: There was no major complications, but in LLGB group were 6 (54.5%) mild gastroschisis. %EWL in MGB group was 66.2 ± 5.2% vs 51.8 ± 2.1% in LLGB, T2DM remission 26 (50%) vs 2 (18.2%) patients, improvement was recorded in 18 (34.6%) vs 7 (63.6%), dyslipidemia in 26 (50%) vs 5 (45.5%), arterial hypertension in 42 (76.9%) vs 11 (100%) patients respectively.
Conclusions: Long-limb gastric bypass is the safe and effective metabolic operation with good short-term results, but mid- and long-term results should be studied before it wide implementation.
BARIATRICS—Laparoscopic
P028—Routine histopathology examination of the excised stomach after sleeve gastrectomy
Significance and comparison with preoperative endoscopy
Islam Omar1, A. Hafez2, J. Freear1
1Sunderland Royal Hospital, South Tyneside and Sunderland NHS Trust, Bariatric Unit, Department of General Surgery, 2Gloucestershire Hospitals NHS Foundation Trust, Surgery, United Kingdom
Introduction: Sleeve gastrectomy (SG) is one of the most commonly performed bariatric procedures. However, the available literature on histological examination of the resected sleeved stomachs is widely inconsistent. This study aimed at assessing the histopathological findings after SG performed in our center compared to the routinely performed preoperative esophagogastroduodenoscopy (OGD) and the intraoperative findings.
Methods: We conducted a retrospective cohort study using the bariatric unit database of all patients who had SG procedures from June 2007 to December 2019.
Results: Out of the 620 SG performed, there were 219 patients with complete data, including preoperative OGD reports, operative notes, and postoperative histopathology reports. We found normal specimens in 43.83% (n = 96) and evidence of inflammation in 50.68% (n = 111) of cases. There were 10 (4.56%) specimens with evidence of inflammation and other lesions and two (0.91%) specimens with lesions only. Twenty-five patients had inflammation, and 10 had lesions on preoperative OGD with negative histopathology reports.
Conclusion: Routine histopathology examination after SG does not change the management, and preoperative OGD can detect inflammatory changes and lesions, which could have been missed with histology analysis only (Tables 1 and 2).
Table 1.
Types of inflammation

Table 2.
Lesions detected on histoathology examination

Figure 1
Bariatrics—physiology
P029—Consent in the time of covid: a two loop audit and quality improvement
Leo Gundle1, C. Aliozo2, M. Mukhtar2
1University Hospitals Dorset, General Surgery, 2Poole, General Surgery, United Kingdom
Covid infection presents a significant mortality risk in patients who undergo a general anaesthetic. For this reason, the Royal College of Surgeons of England have recently mandated these risks be included as part of the consent process for operations under general anaesthetic. Despite this mandate, we have found that discussion of these risks were not consistently made in our department, so we undertook a closed loop audit; we looked at consent forms which include consenting for covid risk. We then performed our intervention (education and posters). Finally we re-audited, including a total of 113 audited records.
Our results showed an improvement from 40.3% pre-education, to 86% post-education, of consent forms addressing covid risks. We re-audited later in the year, demonstrating sustainable change, with 78.4% compliance.
We conclude that clinicians nationally should be reminded of the importance of including covid risks whilst consenting, and that this simple intervention yields effective improvements, such that patients may give proper informed consent.
Bariatrics—physiology
P030—Effect of bariatric operations on gout disease: literature review and retrospective study on 68 gout patients
Midhat Abu Sneineh
Rabin medical center, General surgery, Israel
Introduction: Obesity is one of the most common risk factors for gout development.
In most studies, serum uric acid levels are a strong predictor of mortality from cardiovascular disease.
Other studies suggest that serum uric acid is a strong and independent risk factor for diabetes.
Methods: 2200 morbidly obese patients from Assia Medical Center from January 2011 until January 2017, of them 201 patients had gout disease,of these patients 68 had regular follow up in our system.
We reviewed these patients retrospectively.
Parameters assessed included:
weight
Body mass index (BMI)
Weight loss
Type of bariatric operation
Uric acid level before and until 2 years after the operation
Medical history of gout
Onset of acute gouty attacks after the operation.
Results: These patients had a mean age of 50.7 (range 20 to 74) years and a mean BMI of 41.1 kg/m2.
All patients were preoperatively diagnosed with gout and were taking medications such as (NSAIDs) or allopurinol.
In our series, the prevalence of gout was of 9.1%
58 patients (85%) had at least one gout attack until one year before the operation in comparison to 23 patients (33%) one year after the operation.
17 patients (25%) experienced an acute attack at the first month postoperatively.
There was significant decrease in uric acid level after the operation at one year and two years of follow-up.
(P value less than 0.001 ***).
There was resolution of the disease due to weight loss of 46 patients (67%).
Conclusion: Shortly after the surgery, there is higher incidence of gout attacks in the first month post-operatively so we recommend preoperative prophylactic treatment for these patients but in the long run (≥ 1 year after the surgery) incidence of gout attacks were reduced.
Serum uric acid levels decreased significantly after the operation at one year and two years follow-up.
Bariatrics—physiology
P031—This is why sleeve gastrectomy should be contraindicated in symptomatic and asymptomatic GERD patients
Midhat Abu Sneineh
Hasharon campus, Rabin medical center, general surgery, Israel
Aim:GERD is one of the complications of bariatric operations that my affect quality of life. Our aim is to perform a retrospective cohort study to determine the incidence of symptomatic GERD following different types of bariatric surgery and which operations are considered a contraindication of GERD. In addition, we are attempting to identify the risk factors of GERD after bariatric surgery.
Materials and Methods: Medical records of 729 patients undergone bariatric operations between January 2010 and June 2019 at Shamir (Assaf Harofeh) Medical Center were reviewed.
Results: There were significant difference between the type of the bariatric procedure and the incidence of GERD symptoms after the operation. The incidence of symptomatic GERD in patients who underwent SG was 39.9% (p = 0.0131). This was significantly higher comparing to 16.4% following roux en y gastric bypass, 23.4% following LAGB, and 11% following OAGB. 113 patients out of 718 had a positive swallow test and of these patient 71 developed GERD symptoms post-operatively without correlation to the degree of reflux at the swallow test but with statistically significant correlation to the type of operation especially for SG (P value < 0.001) and to our knowledge this was never reported in the literature.
Conclusion: SG is a good bariatric procedure option but should be contraindicated in asymptomatic reflux contrast swallow study and symptomatic GERD patients preoperatively because of high levels of symptomatic GERD post-operatively. Asymptomatic reflux at contrast swallow study pre-operatively should be considered a risk factor for GERD after the operation.
Bariatrics—physiology
P032—Dumping-like symptoms after Roux-En-Y gastric bypass: case report
Midhat Abu Sneineh
Hasharon campus, Rabin medical center, general surgery, Israel
Background: Insulinomas are the most common neuroendocrine tumors of the pancreas, they are rarely suspected as a cause of hyperinsulinemia in morbidly obese patients because these patients have hyperinsulinemia as a result of insulin resistance. One of the complications of LRYGB is dumping syndrome. The pathophysiology of this hypoglycemia after LRYGB is not well understood, and many theories have been proposed such as excessive GLP-1, nesidioblastosis, and increased glucose effectiveness.
Case Presentation: A 37-year-old female patient with a past history of LRYGB 6 years ago, diagnosed as having late dumping syndrome because of complaints of perspiration, palpitations, hunger, fatigue, aggression, and confusion not related to eating. After the failure of dietician counseling to treat her symptoms, biochemical tests were performed to investigate other possible causes of her symptoms such as hyperinsulinemia, Oral Glucose Tolerance Test demonstrated deep hypoglycemia after 90 min. MRI and endoscopic ultrasound were performed and demonstrated the presence of a well differentiated endocrine tumor of approximately 1.8 cm in diameter in the body of the pancreas.
Conclusion: Bariatric surgeons should be aware of metabolic conditions including hypoglycemia, as a treatable cause of dumping-like symptoms.
Bariatrics—physiology
P033—Does sleeve gastrectomy worsen gastroesophageal reflux disease in obese patients? A prospective study
Andrea Balla1, D. Corallino1, L. Palmieri1, F. Meoli1, C. Sacchi2, D. Badiali2, A. Pronio1, A. Paganini1
1Sapienza University of Rome, Department of General Surgery and Surgical Specialties “Paride Stefanini”, 2Sapienza University of Rome, Department of Translational and Precision Medicine, Italy
Aims: The effects of laparoscopic sleeve gastrectomy (LSG) on gastroesophageal reflux disease (GERD) are still controversial. Aim is to evaluate the impact of LSG and laparoscopic gastric by-pass (LGB) on GERD before and 12 months after surgery.
Methods: Prior to bariatric surgery, the presence of GERD was preoperatively evaluated by Modified Italian Gastroesophageal reflux disease-Health-Related Quality of Life (MI-GERD-HRQL) questionnaire, pH-manometry, endoscopy and Rx-esophagogram. Based on objective parameters, patients without GERD underwent LSG and patients with GERD and/or erosive esophagitis underwent LGB. These exams were repeated 12 months after surgery.
Results: Thirteen patients underwent LSG (group A) and 6 underwent LGB (group B). After surgery, in group A all pH-manometry parameters worsened, with statistically significant difference in median DeMeester score (5.7 vs. 22.7, p = 0.0026). De novo GERD occurred in 9 patients (69.2%), with erosive esophagitis in one. No statistically significant differences were observed regarding endoscopy and Rx esophagogram findings. The MI-GERD-HRQL score improved from a median of 3 to 0. Overall, nine patients underwent LGB, but three were lost at follow up. Preoperative pH-manometry changed the surgical indication from LSG to LGB in 7 out of 9 patients (77.8%). In group B only 6 patients completed the study, and at pH-manometry statistically significant differences were observed in percentage of acid reflux total time, number of reflux episodes lasting > 5 min and DeMeester score (93.8 vs. 3.6, p = 0.009). No statistically significant differences were observed regarding endoscopy and Rx-esophagogram findings. The MI-GERD-HRQL score improved from a median of 6.5 to 0.
Conclusions: LSG has a negative impact on GERD, even in patients without GERD before surgery, while LGB proved to be the intervention of choice in patients with silent GERD. Preoperative pH-manometry may identify patients with silent GERD, to candidate them to LGB rather than LSG. Preoperative endoscopy, Rx esophagogram and the presence of GERD symptoms are not sufficient to decide the most appropriate intervention for these patients. On the other hand, pH-manometry should be used liberally to better establish the correct surgical indication.
Bariatrics—physiology
P034—Effect of One Anastomosis Gastric Bypass on Liver Function Tests: A comparison between 150 and 200 cm Bilio-Pancreatic Limbs
Miraheal Sam, Islam Omar
Sunderland Royal Hospital, South Tyneside and Sunderland NHS Trust, Bariatric Unit, Department of General Surgery, United Kingdom
Context: Some studies have shown that One Anastomosis Gastric Bypass (OAGB) results in derangement of Liver Function Tests (LFTs). We wanted to study this in our patients.
Aims: To study the effect of OAGB on LFTS and to compare the effect of a Bilio-Pancreatic Limb (BPL) of 150 cm (OAGB-150) to a BPL of 200 cm (OAGB-200).
Settings and Design: University Hospital, Retrospective Cohort Study.
Methods and Material: Information was obtained from our prospectively maintained database and hospital’s computerised records.
Statistical analysis: A p-value of < 0.05 was regarded as significant but given the number of variables examined, findings should be regarded as exploratory.
Results: A total of 405 patients underwent an OAGB-200 (n = 234) or OAGB-150 (n = 171) in our unit between October 2012—July 2018. There were significant improvements in Gamma-Glutamyl-Transpeptidase (GGT) levels at 1 and 2 years after OAGB-200 and significant worsening in the levels of Alkaline Phosphatase (ALP) and albumin at 1 and 2 years. There was a significant improvement in GGT levels at 1 and 2 years after OAGB-150, and in Alanine Transaminase (ALT) levels at 1 year. There was a significant worsening in ALP and albumin levels at both follow-up points in this group. OAGB-150 group had a significantly lower bilirubin level at 1 year and significantly fewer abnormal ALP values at 2 years in comparison with OAGB-200 patients.
Conclusions: This exploratory study demonstrates the overall safety of OAGB with regards to its effect on LFTs with no remarkable difference between OAGB-150 and OAGB-200.
Table 1,
Table 1.
Comparison of basic demographics and weight parameters between OAGB-200 and OAGB-150 groups

Table 2
Table 2.
Comparison of liver parameters between OAGB-20 and OAGB-150 groups

Bariatrics—physiology
P035—Effect of one anastomosis gastric bypass on haemoglobin, Vitamin D, Vitamin B12 and parathyroid hormone levels: a comparison between 150 and 200 cm limbs
Islam Omar
Sunderland Royal Hospital, South Tyneside and Sunderland NHS Trust, Bariatric Unit, Department of General Surgery, United Kingdom
Introduction: There is little data on the effect of One Anastomosis Gastric Bypass (OAGB) on Haemoglobin, Vitamins D, Vitamin B12 and Parathyroid Hormone. It is further unclear if an OAGB with a Bilio-Pancreatic Limb (BPL) of 150 cm (OAGB-150) would deliver better outcomes than that with a BPL of 200 cm (OAGB-200).
Methods: We investigated our records to obtain information on patients who underwent an OAGB-200 or OAGB-150 until 31st July 2018 in our unit.
Results: A total of 405 patients underwent an OAGB-200 (n = 234) or OAGB-150 (n = 171). The mean age was 46 ± 10.98 years and 276 (67.3%) were females. The mean preoperative weight and the Body Mass Index (BMI) were 139 ± 29.96 kg and 49 ± 8.14 kg/m2 respectively. With OAGB-200 there was significant increase in anaemia rates at 1 and 2-years compared to preoperative levels with a significant fall in haemoglobin levels. After OAGB-150 there was significant fall in haemoglobin levels at 1 and 2-years but increase in anaemia rate was only significant at 2-years. There was significant increase in PTH levels and number of abnormal values at 1 and 2-years with OAGB-200. With OAGB-150 there was significant increase in the number of patients with hyperparathyroidism at 2-years only.
Conclusion: There was significant decline in haemoglobin levels and increase in the rates of anaemia after OAGB even with BPL-150. There was a significant rise of PTH levels and more patients with high PTH after OAGB-200 at 1 and 2-years. With OAGB-150 cm there was significantly more patients with high PTH at 2-years.
Table 1
Table 1.
Comparison of Haemoglobin, vitamin D, Vitamin B12 and PTH levels between OAGB-200 and OAGB-150 groups

Bariatrics—physiology
P328—Impact of Biliopancreatic Limb on Outcomes of Metabolic Surgery
Kyung Yul Hur
Soonchunhyang Uni. Hosp., General Surgery, Korea
Metabolic surgery gives rise to integrated physiologic changes to improve metabolic disorders. However, inconsistent outcomes even in the same procedure, suggesting the exact mechanism responsible for recovery or recurrence of metabolic symptoms after surgery, have not been elucidated yet.
Mesenchymal cells that reside under the epithelial layer have a regulatory role for site-specific intestinal epithelial regeneration by crucial signaling molecules through epithelial-mesenchymal cross-talking. By the way, site-specific homeostasis of the epithelial renewal system will be disrupted with surgical intervention. Intestinal anastomosis resulted intermingling of the epithelial layer and mesenchymal cells together with the opposite side, which came to an end in significant alteration of epithelial identity. Besides, the physiologic response of compensatory proliferation of the residual intestine against insufficient absorption likely aggravates altered identity. Therefore, enteroendocrine cells are replaced to the opposite intestine, then through the continuous regeneration with proliferation come to an end propagating enteroendocrine cell components with the opposite side. For example, in the duodenal-jejunal bypass (DJB), anastomosis of the alimentary limb with the duodenal first portion, where the K-cell density is exceptionally high, increased secretion of GIP in response to nutrients, showing an incremental pattern in blood glucose over time. Besides, the general morphologic feature of the alimentary limb is rather like that of the duodenum at the second-look operation. On the contrary, anastomosis of the alimentary limb with prepyloric antrum, K-cell does not proliferate on the alimentary limb. Therefore, no early recurrence of hyperglycemia at all in pylorus exclusion DJB.
Likewise, the common channel behind jejunojejunostomy is not an exception. While a long BP (biliopancreatic) limb is not affected by the low density of the K-cell at the distal end, on the contrary, the relatively high K-cell population of a short BP limb causes GIP overflow with unsatisfactory outcomes. Conclusively, the primary determinant of metabolic surgery for non-obese type 2 diabetes is the length of the BP limb. And the second determinant is the complete exclusion of all the duodenal epithelium. Therefore, length of the BP limb is the only determinant for non-obese type 2 diabetes with Roux-en-Y gastric bypass, the postoperative decline of GIP, length of BP limb is paralleled with the resolution of diabetes.
In summary, recommended surgical technique for metabolic surgery for non-obese type 2 diabetes composed with more than 200 cm of BP limb, the complete exclusion of duodenum, preserving pyloric sphincter with single anastomosis exceptionally using interrupted stitches to maintain sphincter function.
Bariatrics—physiology
P347—Chronic abdominal pain after gastric bypass
Jean-Philippe Magema
CHU UCL Namur, Dinant, Visceral Surgery Unit, Belgium
A great part of the population worldwide underwent or will benefit from a GBP. It is estimated that up to 30% of those people will report chronic abdominal pain.
The main difficulty is to compare some symptoms to the general population and assess what is allegedly directly related to Gastric Bypass Surgery.
We reviewed all the literature from the last 20 years and collected the few data available.
Visceral pain has some particular patterns of presentation way different from pain in other locations of the body.
Among the great chapters regarding pain following GBP surgery are those related to stenosis, reflux, ulcers, internal hernias and adhesions. They are well known and not addressed in this talk for time considerations. Among the many other potential causes of abdominal pains we'll focus on some less known, sometimes discussable entities but of major concern in some cases, all potentially related to Gastric Bypass.
Our meticulous work led us to the conclusions that after Gastric Bypass Surgery and Bariatric Surgery in general, a lot of abdominal different pains can occur.
It is often difficult to establish a direct link between the procedure and the symptoms. A lot of diagnostic methods exist, the anatomical modifications due to GBP surgery make some -like endoscopies- more difficult to perform. Laparoscopy can be an important diagnostic and management approach, sometimes the only diagnostic procedure. We should warn our patients about those tedious potential situations and surgeons should report all those situations.
Bariatrics—robotics
P036—Robotic sleeve gastrectomy for morbid obesity our initial experience
Francesco Iaropoli, V Lombardo, L Lucchese, G Pintabona
IRCCS Ospedale Piemonte-Messina, General Surgery, Italy
Aim: Aim of the study We evaluated the initial result and the short-term outcomes of Robotic Sleeve Gastretomy at our Institution.
Methods: A retrospective analysis of the initial 50 patients who underwent Robotic Sleeve Gastrectomy (RSG), between September 2019 and December 2020, was performed. The aim of this study was to assess the safety, the operative time and short-term efficacy of RSG as a treatment option for weight reduction. Data collected included operative time, perioperative complications, length of hospital stay.
Results: Our initial 50 morbidly obese patients, who underwent RSG had an average preoperative BMI 44.6 kg/m2. There were 38 women and 12 men, with mean age 48.6 (range 30 to 61 years). Mean operative time was 1.5 h (range 1.0–2.0). We had no conversion to open or laparoscopic procedure. There were neither postoperative complications nor mortality. Median hospital stay was 3 days.
Conclusions: In our initial experience, RSG is a safe and effective treatment option for obese patient. Follow-up will be necessary to evaluate long-term results.
KEY WORDS: Robotic Bariatric Surgery, Ghrelin, Glucagon-like peptide 1, Morbid obesity, Peptide YY, Sleeve gastrectomy, Surgery, Weight loss.
Bariatrics—robotics
P037—Robotically assisted conversion from SG to RYGBP due to severe GERD: technical options, pros and cons
Anna Curell, J.M. Balibrea, C. González-Abós, E. Butori, A. Ibarzábal, A.M. Lacy
Hospital Clínic de Barcelona, Gastrointestinal Surgery, Spain
Aims: Sleeve gastrectomy (SG) has become the most performed bariatric surgical procedure worldwide. However, reports on appearance of de novo gastroesophageal reflux disease (GERD) or worsening of preexisting conditions are rising. Conversion to Roux-en-Y gastric bypass (RYGBP) is considered to be the gold standard for treating severe GERD post SG. The use of robotic platforms to assist these revisional surgeries offers several technical advantages: wider range of movements, more precision and 3D view, and is therefore considered to being able to offer better results. Our goal is to describe the critical steps during the conversion from RYGBP to robotic-assisted SG by pointing out those phases in which the device offers advantages over laparoscopy as well as those moments in which there may be difficulties.
Methods: Step-by-step analysis of the different maneuvers and their possible variants during DaVinci Xi robot-assisted conversion (RAC) surgery using videos of the interventions belonging to a prospective case series of 10 patients operated on between February and December 2020.
Results: Regarding RACs from SG to RYGBP due to severe GERD, there are several technical possibilities that have to be taken into account: revision of the hiatal region, associating when needed a hiatoplasty to correct hiatal hernias; gastrectomy of the remnant stomach in cases of atrophic gastritis or intestinal metaplasia; tailored dissection and performance of the gastric pouch in order to avoid ischemia of the fundus region. In general terms, the platform makes it easier to perform both gastro-jejunal anastomosis and jejuno-jejunostomy, dissection for making the reservoir and revision of the small intestine. However, the need to release adhesions prior to the definitive docking of the robot as well as some maneuvers in the inframesocolic region can be difficult.
Conclusions: The use of robotic platforms can help to perform more easily various maneuvers and technical variants that may be necessary during SG to RYGBP RACs providing added value in this type of revisional surgery.
Bariatrics—robotics
P039—Comparison of robotic and laparoscopic approach in a team with previous experience in bariatric surgery
Francisco J. Tejero-Pintor, M. Bailon-Cuadrado, P. Pinto-Fuentes, A.D. Bueno-Cañones, P. Marcos-Santos, E. Choolani-Bhojwani, F. Acebes-García, S. Veleda-Belanche, M. Toledano-Trincado, E. Asensio-Díaz, B. Perez-Saborido, F. Labarga-Rodríguez, D. Pacheco-Sánchez
Rio Hortega University Hospital, General and Digestive Surgery Department, Spain
Bbackground: Bariatric surgery is an increasingly used treatment. Obese patients who are going to undergo a bariatric surgery procedure usually associate other comorbidities that increase the risk of suffering postoperative complications. Recently, the robotic approach has been introduced in this field to reduce its morbidity.
Objectives: Our goal is to describe the process of incorporating the robotic approach for vertical sleeve gastrectomy in a surgical team with experience in bariatric surgery procedures, comparing the results in terms of postoperative complications with the laparoscopic approach for the same procedure.
MEthods: Observational study with prospective data collection. All patients who are going to undergo laparoscopic or robotic vertical sleeve gastrectomy have been selected (only comparing with laparoscopic procedures that have alternated at the beginning of the robotic approach learning curve) from June 2018 to February 2020. Anthropometric, preoperative, intraoperative, and postoperative variables were analyzed comparing both procedures with each other.
Results: 86 patients. Women 65%. Age: 47–9 years. BMI 47–7 kg/m2, Smokers 31.4%, HBP 40.7%, DMII 27.9%, ASA II anesthetic risk 33.7%, ASA III 66.3%, robotic approach 73%, No conversion, Drainage 2.3%, Surgical time 95 IQR [80–125] minutes, Global complications 8.1% within which 5.8% Clavien ≥ III, post-surgical stay 2 IQR [2, 3] days. The patients operated on by robotic approach had a higher BMI (47.9 vs 44.5 kg/m2. p < 0.05) and mean surgical time (113 vs 79 min, p < 0.05). However, the overall complication rate was higher in patients who underwent laparoscopic access (13% vs 3.2%, p = 0.08). No other significant differences were found in the analysis.
Conclusion: The robotic approach is a safe and effective option to perform vertical sleeve gastrectomy in a surgical team with experience in bariatric surgery. Although we found statistically significant differences in patients who underwent robotic approach (BMI and longer surgical time), there is a trend that suggests a higher incidence of global complications in those patients who were operated on by laparoscopic approach. More multicenter studies with a larger sample size are necessary to obtain more accurate conclusions and extrapolate the results found.
Colorectal—benign
P040—The use of 3D modelling to improve patient understanding of pelvic floor disorders
Kelly Chu1, A. Przedlacka1, P. Tekkis1, F. Bello2, C. Kontovounisios1
Imperial College London, 1Department of Surgery and Cancer, 2Centre for Engagement and Simulation Science, United Kingdom
Aim: Pelvic floor disorders (PFDs) are visualised and explained to patients via two-dimensional methods such as MRI defecography scans. However, complex pelvic anatomy and multi-factorial pathophysiology of PFDs, together with an objective difficulty in analysing MRI images, make it difficult for a lay person to fully comprehend these conditions. Patients may feel that their lack of understanding impedes their ability to participate in the decision-making process. Three-dimensional (3D) images have been used in various surgical conditions to improve patient understanding. The aim of the study was to create 3D models of PFDs from MRI defecating proctogram scans and assess their impact on patient understanding of the conditions and subsequent satisfaction with the clinical consultation.
Methods: Five anonymised MRI proctogram scans were selected to create 3D models of PFDs. These included images of cystocele, rectocele, uterine prolapse, anismus and pelvic floor weakness. An open-source, free software 3D slicer was used to manually segment the MRI images and create five virtual 3D models of PFDs. 10 patients were subsequently recruited to participate in the study. During the patients’ consultations, they were presented with a traditional 2D MRI defecating proctogram scan and then with a virtual 3D model of the condition. A questionnaire was used to assess their understanding and satisfaction with their PFD diagnosis and management plan after viewing 2D MRI scans and then again after viewing the 3D MRI models.
Results: Patients reported no technical difficulties when viewing 3D models. They were found to have an increased understanding of pelvic floor conditions when 3D models were used. They also experienced increased satisfaction with their consultation when these were utilised during patient-doctor interaction.
Conclusions: 3D models can play an important role in patient education and management in the realm of pelvic floor disorders. Increased patient understanding of the condition and its management options can improve patient experience and sense of autonomy when participating in treatment decision-making and can potentially lead to improved engagement. For further study, personalized 3D models may be of benefit for patients with more unique or complex colorectal conditions necessitating visual communication aids beyond the set conditions chosen for this study’s 3D model creations.
Colorectal—benign
P041—Cecal splenosis mimicking gastrointestinal stroma tumor. Case report and review of the literature
Alberto Riojas, E. López, E. Guzmán
Hospital San José, Escuela de Medicina y Estudios Superiores del Tecnológico de Monterrey, Ignacio Santos, General Surgery, Mexico
Introduction: Abdominal splenosis is a rare condition where autotransplanted ectopic spleen tissue is found in the abdominal cavity after spleen injury or splenectomy. While abdominal splenosis is mostly described as asymptomatic, bowel splenosis can present with abdominal pain, obstipation or gastrointestinal (GI) bleeding. Scarce information on bowel splenosis exists and high index of suspicion is needed for diagnosis. We present the case of a patient with abdominal pain and a cecal mass mimicking gastrointestinal stroma tumor (GIST) found to have bowel splenosis after laparoscopic resection. We expose also a review of literature on intestinal splenonsis.
Presentation of case: A 45-year-old female was evaluated for a 6-month history of abdominal pain in right-lower quadrant. She had past medical history of blunt abdominal trauma and splenectomy 35 years before symptoms. An abdominal contrast-enhanced computed tomography (CT) reported a 4.2 × 4.6 × 4.6 cm solid mass located in the antimesenteric border of the cecum, with calcifications and arterial enhancement (Fig. 1). Colonoscopy found no epithelial lesions. A diagnostic laparoscopy was done, and resection of the mass achieved (Fig. 2). Transoperative histopathological diagnosis revealed ectopic spleen tissue.
Discussion: It is difficult to know whether abdominal pain in bowel splenosis is actually triggered by splenosis itself or by an unrelated cause, making diagnosis incidental. There are no particular imaging findings suggestive of splenosis, and surgical resection is often done under uncertain diagnosis.
Conclusion: Bowel splenosis could present as abdominal pain variable time after spleen injury or splenectomy. Clinical features and imaging characteristics are nonspecific and similar to those of GIST. Most cases of splenosis are diagnosed after surgery.

COLORECTAL—Benign
P042—An audit of the key quality indicators during colonoscopy in a district general hospital in London
Rena AL-Zubaidy, A. Naz, R. Ahmed, T. Singhal
Princess Royal University Hospital, Colorectal Surgery, United Kingdom
Introduction: Colonoscopy is the gold standard investigation for large bowel pathology. It is able to diagnose, surveil and manage neoplasms, and is useful in identifying a wide spectrum of benign disease. It is important to set minimum standards for colonoscopy to maintain its efficacy as an investigation. The British Society of Gastroenterology (BSG) has isolated specific quality indicators of colonoscopy that all units should maintain at high standards. The aim of this audit is to quantify our unit’s compliance with these.
Methods: A list of all colonsocopys taking place at princess royal university hospital between the months of July to December of 2020 was obtained from the hospital database. All were adult scopes and on were excluded. The top 50 colonoscopy reports were reviewed and the data was inputted to an anonymised excel sheet.
Results: Standard quality indicators were analysed including caecal intubation, adenoma detection, bowel preparation, rectal retroversion, polyp retrieval rates and complications. We had a 90% caecal intubation rate, which is just at the minimal national target. Our adenoma detection rate was 26%, which is ¼ colonoscopys, this is well above the 20% aspirational target. Importantly, out of this sample there was a 0% complication rate.
Conclusion: In accordance with BSG guidance, our unit is meeting and surpassing targets, still with plenty room for improvement in areas such as caecal intubation.
We plan to feedback to the unit and re-audit after a period of time to ensure standards are maintained and improved upon.
Colorectal—benign
P043—Appendicocecal cutaneous fistula—a rare complication of appendicitis
Ali Alibrahim
Sheikh Zayed Hospital, Surgery, Iraq
Fistulisation of appendix to other organs or to the exterior through abdominal wall is a rare complication of appendicitis.
We present one such rare case of appendicocecal fistula due to appendicitis in a patient initially managed conservatively(Grid iron incision/drain/ without appendectomy) for appendicular lump. 

Colorectal—benign
P044—Surgical management of acute appendicitis in the elderly, laboratory, histological findings and correlation with length of stay
Shane Keogh, T. El Natout, J. O'Donnell, S. Tormey
University Hospital Limerick, Department of General Surgery, Ireland
Introduction: Acute appendicitis is one of the most common surgical presentations to emergency departments (ED) worldwide. Early diagnosis and laparoscopic appendectomy prevents serious complications such as perforation, improves outcomes and reduces length of hospital stay (LOS). With an aging population, and the diagnosis of acute appendicitis often being overlooked in the elderly, focus has shifted on better care and outcomes in elderly patient presenting with acute appendicitis. Despite laparoscopic surgery being shown to be safe in the elderly, acute appendicitis within the elderly is often diagnosed at a late stage requiring more extensive surgery, increased morbidity and longer hospital stays.
Methods: A single centred retrospective analysis between 2011 and 2020 was performed. A database from patient records was created to include all patients over the age of 70 years that consecutively presented to the ED, received a diagnosis of acute appendicitis (ICD-10: K35) and underwent operative intervention. Laboratory results and histological reports were analysed. C-Reactive protein (CRP), white cell count and final histological diagnosis were recorded. Statistical analysis was performed with SPSS and correlations were assessed using Pearson’s correlation coefficient (r).
Results: A total of 79 patients were identified 53% male (n = 42) and 47% female (n = 37), mean age 81.8 years (range 71–100). 64 patients underwent laparoscopic appendectomy and 15 underwent open appendectomy. Of the open cohort 3 required a laparotomy and colonic resection. Histological analysis revealed that 42% (n = 33) of appendices were perforated, 19% (n = 15) were gangrenous and 9% (n = 7)contained a faecolith. No histological specimens contained evidence of malignancy. Average LOS was 8.73 days (range 1–34 days, Standard Deviation:7.25). Perforated appendices had a higher LOS (12.3 vs. 6.15 days) and higher WCC (12.5 vs 11.09/L), CRP (167 vs 137 mg/dl) on presentation. A positive correlation between CRP on presentation and LOS was observed ( r = 0.416, P = 0.004).
Conclusion: Laparoscopic appendectomy is commonly performed in elderly patients with acute appendicitis, open appendectomy or laparotomy is rarely required. Difficulty in diagnosing this cohort accurately results in elderly patients presenting with perforation which may limit the success of laparoscopic intervention. Additionally with delayed diagnosis patients LOS is extended increasing the cost to healthcare systems worldwide. More subtle symptoms with a more aggressive pathological highlights the seriousness of a missed and delayed diagnosis of acute appendicitis in patients older than 70 years.
Colorectal—benign
P045—Early surgery prevents recurrence in the treatment of diverticular abscess unresponding to antibiotic therapy
Edoardo Forcignano', A. Arezzo, F. Cristaudo, M. Morino
Città della Salute e della Scienza, Department of Surgical Sciences, University of Torino, Italy
Aim: To perform a retrospective analysis of the treatment of patients affected by Hinchey Ib and IIa diverticulitis at our centre in terms of acute diverticulitis relapse, according to the new EAES & SAGES, WSES and ESCP guidelines.
Methods: We collected, retrospectively, all consecutive patients not previously diagnosed for acute diverticulitis and staged at the index episode as Hinchey Ib and IIa, observed at the San Giovanni Battista Nuovo Hospital in Turin. All the CT examinations of the selected patients were doubled checked by a single radiologist to confirm the diagnosis, stage, location and size of the abscess. We verified the relapse rate and the need for resective surgery at 60 days from index episode, dividing the series for type of the treatment (antibiotic, percutaneous drainage, surgery.
Results: Between April 2013 and January 2018, we observed 63 patients with Hinchey Ib and IIa diverticulitis.
First-line treatment was antibiotics alone in 36 patients (57%), in 25 individuals (40%) primary surgery (including 3 temporary stomas reversed within 6 months), and in two cases (3%) a percutaneous drainage. With a minimum follow-up of 24 months, 8 patients relapsed for at least a further episode of acute diverticulitis: 7 (19.4%) previously treated with antibiotic therapy alone and 1 (4%) treated with immediate surgical approach.
Conclusion: With the limitations of a single-centre retrospective study we have shown that up-front surgery performed at the index episode is associated with low rate of relapses, a very low rate of complications and of temporary protective stoma, resembling more an elective treatment than an emergency surgery treatment.
New scientific evidence is needed to identify which type of treatment between up-front surgery, exclusive antibiotic therapy and ultrasound-guided drainage is the best for treating Hinchey II diverticulitis.
Colorectal—benign
P046—Adult colo-colic intussusception due to submucus lipoma: a case report and literature review
Hussein Elbernawi1, Albirnawi2, Kadhem3
1University of Benghazi, General surgery, Libya. 2Gateshead foundation trust, general surgery, United Kingdom. 3Royal Bahrain hospital, general surgery, Bahrain
Intussusception is a rare cause of intestinal obstruction in adults and most cases have a pathological lead point. Sub mucus lipoma is infrequent lesions, although they are the second most common benign lesions of the colon after benign adenomatous polyps.
We present a 42-years male patient presented to hospital with history of recurrent attacks of central abdominal pain associated with constipation for the last three months. His last presentation was the most severe when he demonstrated features suggestive of LBO. CT Abdomen and pelvis revealed colocolic intussuption Leaded by large submucus lipoma. Therefore, rectal contrast was administered to reduce the intussuption. And during same admission LAP transverse colectomy with primary side to side anastomosis performed. Patient had a smooth recovery and discharged home on third post-operative day.
Key words: Lipoma, intussusception, Laparoscopy, and Colectomy.
Colorectal—benign
P047—Stump appendicitis in the era of laparoscopic surgery
Mohamed Salama1, M Salama2, B. Sami1, A. Nasr1
1Our Lady of Lourdes Hospital, General Surgery, 2Trinity College Dublin, Ireland
Introduction: Stump Appendicitis (SA) presents a diagnostic dilemma. Due to its rarity it is neglected and disregarded. Its incidence has increased recently and it is unclear whether this is due to laparoscopic appendectomy. Here, we present 2 cases of SA.
Case1: 27 y/o male presented with severe RIF pain for 1 day. Laparoscopic appendectomy performed 6 months earlier. He was tender in RIF with rebound tenderness, and high inflammatory markers. CT scan revealed SA. Laparoscopic stump appendectomy performed. Histology reported SA.
Case2: 75 y/o female presented with abdominal pain. She was septic with lower abdominal guarding, rebound tenderness and high inflammatory markers. Diagnostic laparoscopy revealed appendicular abscess. Abscess drained and appendectomy performed. Post-operative CT showed SA, settled on conservative management. Histology reported suppurative appendicitis and salpingitis.
Discussion: SA is underreported, underestimated but extremely rare.
Currently there is little evidence to suggest that laparoscopic surgery increases the risk of SA. Uludag et al., 2006 suggested that the potential limitations of laparoscopic surgery including smaller field of vision, lack of 3D perspective, absence of tactile feedback, may increase the chances of longer stump.
Recent literature states that 66% of the reported SA occurred after open procedures. This may be explained by:
Majority appendectomies are open.
Not all SA are diagnosed or reported.
Laparoscopic surgery is performed by experienced surgeon.
Risk factors for SA:
Retro-caecal, sub-serosal.
Complicated appendicitis.
Lack of experience and fear of injury.
SA can be treated surgically or conservatively.
A thorough exploration, meticulous dissection, critical view and the stump less than 5 mm, is imperative to prevent SA.
All appendectomies are performed laparoscopically in our hospital.
Conclusion: SA is extremely rare. High index of suspicion and radiological investigations is necessary. Currently, there is little evidence suggesting that the laparoscopic approach increases its risk.
Colorectal—benign
P048—Percutaneous drainage of periappendiceal abscesses: a new risk score system based on clinical practice for minimally invasive procedure
Giuseppe Massimiliano De Luca1, Enrico Fischetti1, N.M. Lucarelli2, F.P. Prete1, F. Vittore1, M.L. Montanaro1, G. Calculli1, V. Del Vecchio1, A. Gurrado1, M. Testini1
Policlinico Universitario di Bari, 1Chirugia Generale, 2Radiodiagnostica, Italy
Aims: The aim is to review treatment options in patients with periappendiceal abscess and chronic comorbidities in which surgical approach could be life risk treatment. Particularly, percutaneous drainage of abscess is proven to be safe and successful non-surgical treatment in selected patients.
Methods: An 80-year-old female was admitted in emergency at our Academic Surgical Department, with septic state due to abdominal periappendiceal abscess of 9 × 5 cm in diameter (Fig. 1). Physical examination of patient showed asthenia, hyperpyrexia and periumbilical pain migrating to the right lower abdominal quadrant. Laboratory tests revealed neutrophilic leucocytosis and high inflammatory biomarkers. The analysis of the clinical history of elderly patient with severe comorbidities and poor performance, suggested the non-operative treatment of complicated appendicitis, through the performance of the right percutaneous drainage of periappendiceal abscess.
Results: Percutaneous abscess drainage was performed, producing purulent material, revealed positive for Escherichia Coli. Forty days after, the ultrasonographic examination showed complete resolution of abscessual collection with a little residual of 1,5 cm in diameter, with no clinical evidence and no lab tests disorders.
Conclusion(s): To find the effective and safe treatment in acute appendicitis, it could be useful to stratify risk treatment, using a score system based on clinical and laboratory features. The proposed score system (from 0 to 12) evaluates both clinical and laboratory features: fever, leucocytosis, collection diameter, CRP level, ASA group and comorbidities. According to the score system, patients could be classified as low, intermediate and high-risk group (Fig. 2). Low-risk group could be treated with antibiotic therapy alone, intermediate-risk group should undergo percutaneous drainage procedure, and high-risk group must undergo surgical treatment, particularly if clinical conditions worsen rapidly and it is not possible to wait because of septic state. Percutaneous drainage is an efficient option treatment for abscessual collection, especially in patients in which surgical approach could reveal a life-risk treatment.
Colorectal—benign
P049—Histo-pathological correlation of benign rectal neoplasm treated by transanal resection
María Taboada Ameneiro, J.J. García-Orozco, L. Castro Díez, P. Penín De Oliveira, M.L. García Jimenez, M. Torres Díaz, M. Bermúdez Gonzalez, M. Quirós Rodriguez, J.F. Noguera Aguilar
Complejo Hospitalario Universitario A Coruña, Cirugía General, Sudan
Introduction and objectives: Since the beginning of the transanal surgery in 1983 (TEM, transanal endoscopic microsurgery, by Dr. Gerhard Buess) until the development of TAMIS technique (transanal minimally invasive surgery) in 2009 the way we affront the treatment of the rectal polyps (benign polyps and colon adenocarcinoma until T1) improving the visibility, access and the wall thickness resulting in a low morbi-mortality.
The main goals of this study are to stablish a histopathologic correlation of the rectal injuries before and after the intervention and carry on an analysis of the complications associated to the process. The side goal is the analysis of the type of resection carried on, the post-chirurgical recurrence and the need of further intervention.
Methodology: All the rectal polyp excisions performed in a third level hospital during a four year period (2017–2020) by transanal resection were studied retrospectively. The sample size is of 55 patients.
All the patients were put under general anesthesia. The surgical position was lithotomy. For the intervention open technique and TAMIS were performed. Gelpoint, Sils and Univec tools were used.
The following variables were collected: sex, age, previous comorbidities, pre and post histopathological aspects, later complications, hospital stay, recurrence, need for intra-abdominal resection and, neoplasm characteristics as height, situation and size.
Results: 35 patients of the sample are male (64%) and 20 (36%) are female. The mean age is the 71.8.
Attending to the anatomic-chirurgical classification we can stablish that 25 (45.5%) are placed in the low rectum, 19 (34.5%) in middle rectum, and 2 (3.5%) in upper rectum. We cannot classify the position in 9 (16.5%) cases.
10 (18%) of the 55 rectal polyps have histology compatible with adenocarcinoma previous to the intervention. The remaining 45 (82%) polyps have histology compatible with villous adenomas with no evidence of adenocarcinoma.
In the group of pre-chirurgical benign polyps, we found 8 (18%) cases of adenocarcinoma in the final pathological anatomy being the total of invasive carcinoma of 18 (33%).
Note that only 3 (17%) adenocarcinomas show the same stage before and after the surgery. 11 (61%) cases was infra estimated and 3 were over estimated.
The number of total complications was 8 (14.5%) from which 2 need re-intervention (bleeding and peritonitis).
Conclusions: The 18% of the neoplasm diagnosed proved to be adenocarcinoma. Of this, 71.5% were T1 and 28.2% were T2. A 78% of the adenocarcinoma diagnosed was incorrectly staged despite of the performance of a NMR.
Colorectal—benign
P050—Laparoscopic treatment for appendicular stump appendicitis
Gabriela Rojas de la Serna, J. Cortina oliva, A. López Sánchez, J. Riquelme Gaona, J. Cuevas Toledano, M. López Saiz, C. Moreno Sanz
Genera hospital La Mancha centro, Gastrointestinal surgery, Spain
Aims: Acute appendicitis is one of the most common abdominal surgical emergencies, being stump appendicitis an uncommon late postoperative complication. In a recent systematic review of 3130 appendicectomies, five were appendicular stump appendicitis (0.15%). Due to the low incidence of this entity and its low index of suspicion after a previous appendectomy, its late diagnosis leads to a higher incidence of complications and postoperative morbidity. We present the case of a patient with appendicular stump appendicitis.
Methods: A 45-year-old male with history of obesity, type 2 diabetes, high blood pressure, apnea-hypoventilation syndrome and appendectomy 28 years before due to acute appendicitis. The patient attended emergency room consultation due to 72-h abdominal pain. At physical examination presented an enlarged McBurney scar and signs of peritoneal irritation. Blood tests objectified an elevation of acute phase reactants. The computerized abdominal tomography evidenced appendicitis of the appendicular stump complicated with perforation.
Results: The patient underwent emergency laparoscopic surgery with three trocars. Dissection of the right parietocolic was accomplished identifying a 3 cm appendicular stump, perforated with an small abscess and an appendicolith. Abscess drainage, remnant appendectomy and placement of an aspiratory drainage was performed. The histological result confirmed the diagnosis of appendicitis. The patient was discharged on the fifth postoperative day without complications and is currently asymptomatic.
Conclusions: Stump appendicitis is a rare and infrequent entity. Late diagnosis can lead to complications such as perforation and sepsis. Minimally invasive surgery is a safe and effective option in patients previously operated by laparotomy.
Colorectal—benign
P051—Chilaiditi’s syndrome and unresecable polyp: an unusual combination as cause of abdominal pain
Isabel María Muñoz Núñez, S. Alonso García, B. Cantarero Jiménez, S. Calzado Baeza
Hospital Santa Ana Motril, Cirugía General, Spain
Aims: The aim of this poster is to describe a clinical case of Chilaiditi syndrome in a patient with an endoscopically unresecable polyp in the Bauhin valve.
Methods: A 57-year-old patient with a personal history of mechanical mitral valve, diabetes mellitus, dyslipidemia and grade 1 obesity. This patient suffers from abdominal distension and colic pain for years. A colonoscopy informs of an unresecable polyp in the Bauhin valve with approx 3 cm diameter. It was biopsied without findings of malignity (hyperplastic polyp with low grade dysplasia). Abdominal and pelvic Computed Tomography (CT) shows a Chilaiditi syndrome without other important observations. After analyzing the clinical case, a right laparoscopic hemicolectomy was decided to be performed. In the surgical act we needed to descend the hepatic angle of the colon, which was over the liver. There were not too many adherences to resect and the colon was mobile. A side-to-side ileocolic anastomosis was performed.
Results: In the postoperative period there were no complications. The intestinal transit was correct in the third day after surgery. Months later, the patient does not have colic abdominal pain or distension at all.
Conclusions: Chilaiditi’s sign is caused by intestinal interpositions between liver and diaphragm. Usually, the different colon ligaments and adherences avoid its mobility. However, there are specific conditions which could cause this sign, such as elongated colon or its suspensory ligaments, megacolon, etc. This sign is an incidental find in 0.025–0.28% of radiographies. When Chilaiditi sign causes symptoms is called Chilaiditi’s syndrome. It is more usual in men (ratio 4:1). Related to clinical manifestations, we can highlight abdominal pain, nausea, vomits and anorexia. Besides, Chilaiditi can be a sign of malignant colon disease. All in all, Chilaiditi’s syndrome should take part in the differential diagnosis of abdominal pain.
Colorectal—benign
P052—A novel treatment for bleeding internal hemorrhoids—coil embolization of the superior rectal artery
Nouha Hinnawi1, Yifat Yosef Lishtzinsky1, M Saksonov2, S Litvin2, M Duberman2
University hospital Assuta Ashdod, 1General Surgery, 2Interventional Radiology, Israel
Aims: The Main aim of the study was to evaluate the efficiency and safety of superior rectal artery coil embolization to treat hemorrhoidal bleeding. The secondary aim was to investigate any changes in quality of life.
Method: The study was a retrospective review of prospectively collected data, evaluating patients with symptomatic first to third degree hemorrhoidal disease, according to Goligher classification, treated with superior rectal artery embolization. All patients filled out a SF-36 quality of life questionnaire prior to and after the procedure; the bleeding severity was assessed according to the bleeding severity score. Selective superior rectal artery embolization was performed by experienced interventional radiologists, through the right common femoral or the left radial artery, using several embolization coils (TORNADO [COOK Company]) several milimeters in diameter. A multidisciplinary team approach was carried out by intervention radiologists and surgical proctologists. We observed immediate and short-term outcomes and assessed the complications.
Results: Thirteen patients (5 women and 8 men) were included in the study, between the ages of 33–70. Angiographic intervention was not possible for one patient due to arthrosclerosis of the IMA and therefore was refereed to surgical hemorrhoidectomy; the immediate angiographic success rate was 100% with short-term clinical success rate of 71% defined as cessation of bleeding or as major improvement in bleeding frequency, no major post procedural complications were reported. Significant improvement in patient's quality of life parameters was evident. During follow-up, two patients had recurrent episodes of rectal bleeding for which further intervention was needed, one underwent hemorrhoidectomy and the other underwent another angiographic intervention with angiographic success but poor follow up results and therefore was also deferred to a surgical procedure due to symptomatology.
Conclusion: In our study superior rectal artery embolization is a safe and feasible procedure, with good clinical improvement in bleeding control and significant improvement in quality of life measures. The results warrants further large randomized trials comparing this novel procedure to conventional hemorrhoidectomy.
Colorectal—benign
P053—A new endorectal approach to correct rectovesical fistula: Overlapping rectal muscle-plasty by TEM
Eiji Kanehira, T. Tanida, A. Kanehira, K. Takahashi, M. Iwasaki, K. Sagawa
Medical Topia Soka, Surgery, Japan
Background: Rectovesical fistula (RVF) as a complication developing after radical prostatectomy becomes refractory. Symptoms, such as faecaluria and/or incontinent urination from the anus, significantly deteriorate patients’ quality of life. Although a variety of surgical procedures has been attempted to treat RVF, none of them has been regarded as a standard treatment to date. We developed a new method to correct RVF, “overlapping rectal muscle plasty”, which is performed by transanal endoscopic microsurgery (TEM). Herein we demonstrate our new operative technique and report the clinical outcomes.
Methods: The novel surgical technique is called “overlapping rectal muscle-plasty”, which is performed under TEM. During the new procedure, complete fistulectomy was firstly performed, and then the proper muscle layer of the rectum was folded, overlapped, and sutured to create a thick wall between the rectum and urinary bladder (Attached 14 Figures). This operation was carried out in 15 patients with refractory VRF following radical prostatectomy. Their hospital records were retrospectively collected and analyzed.
Results: The operation was safely performed in all patients with an average time of 127.2 min. Fistula was corrected in 13 patients (86.7%), who were then freed from both urinary and intestinal diversions.
Conclusions: Overlapping rectal muscle-plasty by TEM is a safe procedure. The success rate seems to be acceptable in selected patients. This new repair method may be considered as a minimally invasive option in the surgical treatment of refractory VRF after radical prostatectomy.
Colorectal—benign
P054—Use of diagnostic imaging and routine follow up colonoscopy to evaluate elderly patients with acute appendicitis: a 5 year single centre cohort study
William Duggan, E. Burke, S. Khan, K. Mealy
Wexford General Hospital, Surgery, Ireland
Background: Acute appendicitis (AA) is relatively uncommon in patients over the age of 50 and may represent a first presentation of colorectal carcinoma. Rates of complicated appendicitis are also higher amongst this cohort. Negative appendicectomy is associated with complication in 25% of elderly patients compared to 3% in younger patients. The objectives of this study were three-fold: firstly to evaluate the use and accuracy of pre-operative diagnostic imaging in evaluating patients over the age of 50 with suspected AA. Secondly, to evaluate the impact of pre-operative imaging on rates of peri-operative complication across this cohort. Finally to evaluate the detection rate of colorectal cancer on colonoscopy following diagnosis of AA.
Methods: All patients over the age of 50 diagnosed with AA at our centre between September 2015 and September 2020 were included for analysis. Clinical data was obtained via retrospective review of patient medical records.
Results: Of 106 patients diagnosed with AA, 99 (93.4%) underwent appendicectomy. 61 patients (57.5%) underwent a diagnostic CT,25 (23.6%) a diagnostic Ultrasound.CT was associated with an overall diagnostic accuracy of 85.1%, and Ultrasound a diagnostic accuracy of 73.6%. Negative appendicectomy rate was 16% in patients who did not undergo pre-operative imaging, compared to 7% in those who did. The rate of complicated appendicitis was 43% in patients over the age of 60, compared to 18% in those patients aged between 50–59. The overall incidence of colorectal carcinoma was 3.7% across the cohort. 24 patients (22.6%) were followed up with colonoscopy, no new cancers were identified at colonoscopy.
Conclusion: Appendicitis is often complicated in elderly patients, diagnostic imaging should be undertaken in all patients over the age of 60 in whom AA is suspected. We do not recommend routine follow up colonoscopy in this cohort.
Colorectal—benign
P055—Laparoscopic versus open re-operations within 30 days after lower gastrointestinal tract surgery: a retrospective comparative study
Francesco Mongelli, S. Deretti, G. Staccini, N. Murgante, P. Majno-Hurst, D. Christoforidis
Ospedale Regionale di Lugano, Surgery, Switzerland
Background: Re-operations within 30 days after lower gastrointestinal tract surgery are associated to high morbidity and mortality. Laparoscopic approach has been reported as feasible and safe in selected patients, but comparative data to laparotomy are scarce.
The aim of this study was to review our experience in laparoscopic re-operations and compare it to laparotomy.
Methods: From January 2012 to December 2016, patients undergoing a re-operation within one month after lower gastrointestinal tract surgery were included and divided into laparoscopy and laparotomy groups. The primary endpoint was successful re-operation, defined as recovery without any of the following: conversion to laparotomy, need of further invasive treatments or death. Secondary outcomes were the length of hospital stay and 30-day morbidity and mortality. Demographic, clinical and surgical characteristics were collected and analyzed.
Results: Out of 114 patients who underwent a re-operation, 71 met the inclusion criteria. Thirty (42%) patients underwent laparoscopy and 41 (58%) laparotomy. Thirty (42%) patients were male and median age was 72.0 years-old. The initial operation was elective in 24 (34%) patients and 50% of the initial operations were colorectal resections in both groups.
Multivariate analyses showed that type of approach did not affect the re-operation success rate. Laparotomy was an independent predictor of prolonged hospital stay (OR 3.582, 95%CI 1.191–10.776, p = 0.023) and mortality (OR 13.123, 95%CI 1.301–131.579, p = 0.029).
Conclusions: Re-operations within 30 days after lower gastrointestinal tract surgery may be safe in selected patients, as effective as laparotomy, and associated with shorter hospital stay and lower mortality rates.
Colorectal—benign
P056—Video-assisted anal fistula treatment: a novel intervention in anal fistulas
Arshad Hussain1, A. Pathan1, A. Bhurgri1, A. Sattar Rahpoto2, S. Juneijo3
Liaquat University of Medical & Health Sciences Jamshoro, 1General Surgery, 2Radiology, 3Bilawal Medical College Jamshoro, Anesthesia, Pakistan
Objective: To explore the outcome of video-assisted anal fistula treatment in anal fistuals at tertiary care teaching hospital.
Patients and Methods: The cross sectional case series study of one year (June 2017 – May 2018) was conducted in department of surgery Liaquat University Hospital. All the patients having age ≥ 18 year of age, either gender, had anal fistula and underwent video-assisted anal fistula treatment were included in the study while the exclusion criteria were tuberculosis, carcinoma of rectum and inflammatory bowel disease. The diagnosis of the anal fistula was based on clinical history and physical examination, MRI pelvis, fistulography and ultrasound. The patients were followed and the outcomes were reviewed. The frequency and percentage was calculated for categorical variables and mean ± SD was calculated for numerical variables. As this was descriptive case series so there was no any statistical test of significance was applied.
Results: During one year study period, total seventy two (72) patients underwent video-assisted anal fistula treatment with means age 51.77 ± 9.75 (SD) with median follow-up of 6 months. There were no complications and all patients were treated as day cases. The recurrence was detected in 3 (4.1) patients. During follow-up all patients reported themselves as cured (asymptomatic). The mean ± SD for operative time (minutes), hospital stay (days) and return to work (days) was 40.62 min, 2.51 ± 1.5 days and 6.55 ± 3.83. Minor discharge with itching was observed which resolved till next visit at 4 to 6 weeks while no fecal incontinence was observed.
Conclusion: It has been concluded that VAAFT technique is the safe, sphincter-saving procedure performed entirely under direct endoluminal vision with the main benefit is minimal risk for incontinence and hospital stay and early return to work whereas the fistuloscopy helps to detect any secondary tracts or chronic abscesses.
Keywords: Anal Fistula video assisted.
Colorectal—benign
P058—The influence of modern methods of diagnosis and treatment of acute appendicitis on its incidence among adult population
Aleksandr Ukhanov, D. Zakharov, S. Zhilin, S. Bolshakov, A. Leonov, V. Ambartzumjan, K. Muminov, E. Tiunova, J. Aselderov
Central municipal clinical hospital, surgical, Russia
Background: Acute appendicitis over the past hundred years has been a leading condition of acute abdominal surgical pathology. However, over the past decades, there has been a decrease in the number of patients with acute appendicitis among urgent surgical patients, both in absolute and percentage numbers. Due to analyzing the work of the municipal hospital over the past 15 years, the dependence of the number of appendectomies from the using of modern methods of diagnosis and treatment was revealed.
Materials and methods: Between 2006 and 2020 years 4746 patients with acute appendicitis and its complications were treated in the surgical department central municipal clinical hospital in Velikiy Novgorod. Operations were performed in 4641 patients: 2749 patients (59%) underwent laparoscopic appendectomy, and open interventions were performed in 1892 (41%) patients.
Results: Over the course of these 15 years, the number of laparoscopic operations in acute appendicitis steadily increased from 21.9% in 2006 to 98.7% in 2020. During study period, the average adult population living in the hospital service area did not change significantly and included 175,000 people. During 15 years, there was a steady decrease in the number of patients with acute appendicitis from 401 patients in 2006 to 252 patients in 2020. Since 2012, hospital was able to conduct round-the-clock ultrasonography in addition to laboratory analysis. Due to this, 35% of patients with the suspected acute appendicitis had a different diagnosis. Since 2016, in cases when it was impossible to exclude acute appendicitis after clinical, laboratory and instrumental assessment, the diagnostic laparoscopy was recommended. Another pathology was diagnosed in 20% of patients who underwent diagnostic laparoscopy. As a result, the number of non-destructive forms of inflammation of the appendix (catarrhal appendicitis confirmed by histological examination) decreased from 15% in 2010 to 1.5% in 2020.
Conclusions: In our opinion, a more accurate diagnosis of acute appendicitis at both the preoperative and intraoperative stages contributed to a decrease in number of operated patients. All these facts led to a decrease in the number of unnecessary appendectomies and reduced the hyperdiagnostic of acute appendicitis. Also the introduction of laparoscopic operations led to a decrease in the registration of acute appendicitis from 2.3 people per thousand in 2005 to 1.3 people per thousand of adult population in 2020.
Colorectal—benign
P060—Is there an optimal timing for elective surgery in diverticular disease?
Annamaria Di Bella, R. De Vincenti, G. Vecchieschi, L. Gatti, G. Alemanno, A. Bruscino, M.L. Vuolo, D. Perini, P. Prosperi
Careggi University Hospital, Emergency Surgery Unit, Italy
Aim: In the last years, conservative management has become the first-line approach to diverticulitis, also in case of complications, reserving emergency surgery only for selected cases and/or for patients non-responsive to medical therapy. Furthermore, the optimal long-term strategy, the indications and the timing of elective surgery after the recovery from the acute phase of the disease are still unclear. Aim of this work is to establish if there is an optimal timing in planning an elective intervention after an episode of acute diverticulitis.
Matericals and methods: All the patients who underwent elective laparoscopic sigmoidectomy for diverticular disease in the period 1/01/2017–31/12/2019 were enrolled. Patients were divided into two groups based on the time elapsed between the last episode of acute diverticulitis and surgery: group A (< 30 days) and group B (> 30 days). Exclusion criteria were the need of surgical intervention in the acute phase and the need of primary open surgical approach.
Results: In the study period, 225 patients (60 in group A; 165 in group B) met the inclusion/exclusion criteria. The two groups resulted homogeneous regarding epidemiologic, anthropometric and anamnestic characteristics. Mean surgical time, difficulty in adhesiolysis, mean number of hospitalization days and conversion rate did not show significant differences between the two groups (respectively, p = 0,843; p = 0,896, p = 0,208; p = 0,233), as well as number and severity of complications, measured according to Clavien-Dindo classification (respectively p = 0,527; p = 0,613). Overall mortality was 0%. In A group, a protective diversion stoma was more frequently created than in group B (30% vs 10%; p = 0,008).
Conslusions: This study demonstrates no differences in outcomes between early and delayed elective surgery, showing similar rates of complications, operation duration and length of hospital stay. An early timing for surgery is feasible and safe and could be useful for those patients with relapsing complicated diverticulitis, despite the higher risk of creating a temporary stoma and the consequent need for further hospitalization in order to reverse it.
COLORECTAL—Benign
P061—Small bowel arteriovenous malformation, presenting as obscure GI bleeding
Muhammad Haris Mirza, E. Nzewi
Cavan General Hospital, General Surgery, Ireland
Background: Lower gastrointestinal bleeding (LGIB) is a common surgical condition presenting to the emergency department. Anatomically, it is differentiated from upper gastrointestinal bleeding by the location of bleeding source distal to the ligament of treitz. The most common cause of LGIB is diverticulosis, followed by ischemic colitis and various anorectal conditions. Here we report a rare cause of small bowel bleeding, which presented as lower gastrointestinal bleeding.
Case presentation: A 63-year-old woman presented to emergency department with a 2 day history of sudden onset, dark red rectal bleeding, without any associated systemic features. Her haemoglobin level dropped significantly, necessitating blood transfusion. Her upper and lower gastrointestinal endoscopy did not reveal any source of bleeding. Due to ongoing blood loss, a CT mesenteric angiogram was performed which showed extravasation of contrast into the distal ileum. She underwent a laparotomy where an AVM of the ileum was found, culminating in limited ileal resection with primary anastomosis. She recovered well post-operatively with no further bleeding.
Discussion: Small bowel bleeding, previously described as obscure gastrointestinal bleeding, is the underlying etiology of acute lower gastrointestinal haemorrhage in around three-quarter of cases where no obvious bleeding source is localized on endoscopic examination. American college of Gastroenterology guidelines suggest Video Capsule Endoscopy (VCE) as the investigation of choice for evaluation of small bowel bleeding. However, an emergency mesenteric angiography has been suggested for unstable patients with acute, obvious GI bleeding. Endoscopic electrocoagulation is a proven management option for intestinal angiodysplastic lesions. However, a study from Massachusetts clearly showed the efficacy of surgical treatment in terms of re-bleeding, over medical and endoscopic treatment. Similar cases reported in the literature have described surgical treatment as the definite management. Nonetheless, large randomized studies are essential to demonstrate the efficacy of one treatment modality over another, for safe and effective patient management.
Conclusion: Small bowel bleeding is a common cause of LGIB where initial endoscopic examination is normal. CT mesenteric angiography is indicated for evaluation in hemodynamically unstable patients, while VCE is the gold standard for stable LGIB patients. Surgical resection is usually required for definite haemorrhage control and final diagnosis.
Colorectal—benign
P062—Stercoral Perforation of the Transverse Colon: A Case Report
Gabriel Orsi, C. O'Reilly, K.V. Subramanian, A. Khair, S.A. Malik, M. Aremu
Connolly Hospital Blanchardstown, General Surgery, Ireland
Introduction: Stercoral perforation of the colon is characterized by perforation of the colon secondary to direct pressure from hardened stools. It accounts for 3.2% of colonic perforations and estimated mortality ranging from 32–57%. Stercoral perforations of the colon are rarely reported in the transverse colon (5.9%). In this case report, we discuss the clinical presentation, diagnosis and management of a patient with stercoral perforation of the transverse colon.
Method: An 81 year old lady was brought from the nursing home to the emergency department with complaints of abdominal pain and distension, vomiting, delirium and fever (38.8 °C). On examination, her abdomen was distended with generalised tenderness and guarding, maximal in the lower abdomen and digital rectal exam showed normal stools.
Result: Her blood investigations showed a CRP of 50 mg/dL, WCC 9 × 109/L, Hb of 16 g/dl and Lactate of 3 mmol/L. Abdominal CT scan showed free air and fluid in the peritoneal cavity secondary to perforated transverse colon and generalised faecal loading of the colon. The patient was taken to the theatre for laparotomy and this revealed a 3.5 cm perforation of the distal transverse colon with solid faeces protruding through the perforation and surrounding faecal peritonitis. A transverse colectomy resection with end colostomy was performed. Histology of the specimen confirmed a large 3.5 cm perforation in the transverse colon with mucosa showing surface erosions and fibrin deposition and associated mesenteric acute suppurative inflammation. There is no evidence of malignancy. Patient was transferred to the intensive care unit (ICU) post-operatively where she required high doses of inotropic support and renal dialysis for acute renal failure. Unfortunately patient deteriorated rapidly in the ICU and died the following day from sepsis.
Conclusion: A strong clinical suspicion must be present to diagnose stercoral perforations of the colon early. Risk factors must not be considered exclusively with the absence of ongoing constipation not being an excluding criterion for this condition. Chronically constipated patients must be adequately managed to reduce the risks and early CT investigation must be performed to minimize the consequences of this unusual but deadly complication.

COLORECTAL—Benign
P324—Descending perineum syndrome and laparoscopic posterior Pelvic Organ Prolapse Suspension (pPOPS) with a V-shaped prefolded polyurethane coated mesh
Giorgio Querini, Maura De Francesco, F. Calabrese, M. De Francesco, S. Zonta
Ospedale Unico Plurisede ASL-VCO, General Surgery, Italy
Background: Descending perineum syndrome (DPS) can be defined as a descent of pelvic organs due to pelvic floor support structures weakness. The aetiology is unknown and probably multifactorial. When pelvic prolapse mainly affects the posterior compartment organs, proctological dysfunctional symptoms become prevalent in the clinical picture. If conservative therapy failed, DPS is suitable for a surgical treatment in order to restore a normal topography and a correct function of pelvic organs. We propose a laparoscopic posterior Pelvic Organ Prolapse Suspension (pPOPS), using a V-shaped pre-folded polyurethane coated mesh, inspired by the POPS technique used in gynecology but specific for the middle and posterior pelvic compartment.
Methods: From 2018 to 2020 we treated 25 female patients with pelvic prolapse with the pPOPS technique. After inducing pneumoperitoneum via a Verres needle, three trocars are placed: a 12 mm camera port in umbilical region, a 12 mm trocar in the right abdomen side and a 5 mm trocar symmetrically in the left abdomen side. The uterus is lifted up by a transfixed stitch. The posterior vaginal fornix is pushed up by a valve to reach a correct exposure of recto-uterine pouch. Therefore, the mesh is introduced in abdominal cavity through the 12 mm operative trocar. We use a V-shaped mesh (Wing Mesh Pro Compact, Angiologica s.r.l.—Italy), having each polypropylene branch (2 × 23 cm) folded on itself (2 × 6 cm) in order to simplify the correct placement. The mesh’s midst (2 × 4 cm), polyurethane coated, is fixed by three polypropylene 2–0 stitches to the lateral and posterior vaginal fornices and to the anterior rectal wall. Then a 3 cm skin incision is made over the anterior superior iliac spine bilaterally, in order to gain the external oblique fascia. Through these incisions, a pre-peritoneal tunnel is bilaterally created. As close as possible to the lateral vaginal fornices, the peritoneum is perforated and the mesh’s wings are pulled out through the tunnels via the forceps’ tips. By a symmetrical mesh’s branches traction, a correct pelvic organs suspension is obtained. At last, the mesh’s extremities are fixed to the external oblique fascia by polypropylene 2–0 stitches.
Results: All patients treated were discharged in the 5th post-operative day. Mean operative time was 42 ± 13 min. No intraoperative complication occurred, all patients reported an improvement in symptoms. No complication related to mesh implant, such as erosion or infection, was highlighted along with patients follow up. Radiological post-operative examination documented the markedly reduction of the DPS in all patient treated. No recurrency was reported.
Conclusions: Our pPOPS technique is a feasible, easy and safe procedure. Compared to the others laparoscopic lateral suspension techniques, the advantages of our pPOPS procedure are threefold. Firstly, the mesh’s fixation to the posterior vaginal fornix and to the anterior rectal wall better restores the normal topography of pelvic organs. Secondly, it prevents the future occurrence of cystocele and rectocele. Lastly, the mesh’s midst, polyurethane coated, and the laparoscopic approach minimize abdominal adhesion formation and increases the patient’s safety regarding the risk of infection and erosion.
Colorectal—benign
P338—Laparoscopic approach in surgical treatment of a giant retrorectal tumor: Rare Case series
Jun Seong Chung, J.K. Ju, H.D. Kwak
Chonnam National University Hospital, Colorectal Surgery Department, Korea
Introduction: Retrorectal tumor is a rare disease with non-specific signs and symptoms. Surgical resection of a retrorectal tumor can bring favorable results, but these diseases are frequently unrecognized, misdiagnosed, and mistreated due to the narrow anatomical pelvic space.
Methods (Case series): We analyzed patients who were diagnosed with the retrorectal tumors by abdominal computed tomography and underwent laparoscopic resection of the retrorectal tumors at the Colorectal Surgery Department of Chonnam National University Hospital, Gwangju, South Korea, between 2017 to 2020. We aimed to evaluate the results of laparoscopic resection of the retrorectal tumors according to the preoperative symptoms, the size and location of the tumor, the perioperative complications, the histopathologic findings, the length of stay, recurrence and follow up.
Results: This study included 5 patients (3 females) with a median age of 53.2 years (range 34–60 years). Three patients complained anal bleeding, bowel incontinence, tenesmus, and neuropathic pain. Two patients were incidentally detected. The median size of tumors was 5.8 × 4.3 cm (range 3.5–7.5 cm). All tumors were located in retrorectal space. Four out of five tumors were located above the coccyx level. One patient had a postoperative surgical site infection which is Clavien-Dindo (CD) classification grade I. The biopsy revealed epidermoid cyst in 2 female patients. The others resulted in tailgut cyst, lipoma, and keratinous cyst. The median length of stay was 7.8 days (range 5–11 days) and median follow-up was 49.2 days (range 14–132 days). There was recurrence in 2 patients who had an incomplete tumor resection due to high possibility of damage to surrounding nerves and vessels.
Conclusion: Although laparoscopic resection for retrorectal tumors has limitations regarding incomplete resection according to the location of the tumor, laparoscopic resection is a safe and feasible surgical method, even for bulky retrorectal tumors, with a short recovery period.
Colorectal—IBD
P063—Laparoscopic ileocecal resection in Crohn's disease: the experience of one institution
Mikhail Danilov, A. Leontiev, A. Baychorov
MCSC A.S.Loginov, coloproctology, Russia
Introduction: Surgery plays a major role in the management of complications of Crohn's disease, in particular obstructive and septic. Due to transmural inflammation of the intestinal wall, the risk of surgical complications in this patients group is extremely high. Routine surgical treatment of patients with Crohn's disease is considered if there is intestinal obstruction in the stage of compensation, data for the presence of interintestinal fistulas, or in patients with a high index of disease activity (Best index more than 220). Intestinal obstruction in Crohn's disease is most often associated with stricture of the terminal ileum (35–50%), jejunum (22–36%), and less often with the localization of the pathological process in the colon (5–17%). As a rule, when intestinal obstruction occurs, treatment begins with intensive drug therapy, provided that there are no data for peritonitis and septic conditions. Recently, thanks to the use of anti-TNF drugs, many patients have been able to achieve stable remission and at least postpone surgical treatment. On the other hand, long-term use of anti-TNF drugs may lead to an increased risk of developing lymphoma and lymphoproliferative diseases, as well as skin neoplasms. Aggressive drug therapy can often lead to the development of granulomatous enteritis, scarring in the small intestine and the formation of a stricture that requires urgent surgery. Extended resections in Crohn's disease are not recommended and inappropriate, since repeated surgical interventions can lead to short bowel syndrome. Therefore, the most common operation for stricture Crohn's disease is ileocecal resection, which can be performed both urgently and routinely.
Aim: The aim of this study is to evaluate the results of performing ileocecal resection in patients with strictured Crohn's disease.
Materials and methods: To diagnose Crohn's disease, all patients, without exception, underwent a total colonoscopy with ileoscopy, according to which the mandatory endoscopic signs characteristic of Crohn's disease should have been: aphthous ulcers, a "cobblestone" mucosal change and a segmental (intermittent) nature of the lesion. Before surgery, all patients underwent CT-enterography to determine the extent of the bowel lesion and to plan the resection volume. To assess the activity of Crohn's disease, we used the Best index, where values less than 150 are characterized by minor manifestations of the disease, and values over 450 are characterized by a super-severe course.
Results: We performed 46 ileocecal resections for a complicated course of Crohn's disease. The average age of the patients was 37.6 years, of which there were 21 women and 25 men. Eighteen patients (39.1%) were operated on for urgent and emergency indications, the average bed-day of patients in this subgroup before surgery was 8.8. The rest (28 patients)—in a planned manner, the indication for surgical intervention was the ineffectiveness of conservative therapy, the presence of a fibrous component in the thickened wall of the ileum according to CT enterography, and subcompensated intestinal obstruction. Conversion was performed in 4 (8.7%) patients due to technical difficulties caused by: in 2 patients due to massive infiltration of the ileal mesentery, in one—from a pronounced adhesive process in the right ileal region after appendectomy, and one has visceral lipomatosis. In the postoperative period, there were complications that required repeated interventions: 1—bleeding from the mesenteric vessels, 1—anastomotic leakage, 1—early adhesive obstruction. In the first case, relaparoscopy and suturing of the mesentery were performed, postoperative smooth, no recurrence of bleeding was noted. Anastomotic leakage was diagnosed on the 4th day of the postoperative period, the anastomosis was uncoupled (Lachey-type surgery) and sanitation relaparotomy. Adhesive obstruction required nasointestinal intubation.
Purulent-septic wound complications developed in the postoperative period in 4 patients (8.7%), it is worth noting that all were operated on urgently, with one patient with anastomotic leakage. There were no dysuric phenomena; the transurethral catheter was removed on the first day of the postoperative period. The postoperative period was complicated in 4 patients by the layering of Clostridial infection, which required the administration of per os vancomycin at a dosage of 500 mg three times a day, and as a consequence, the prolongation of the patient's stay in the hospital (6.2 and 12.5, respectively, p = 0.02) The intensity of pain syndrome on the 2nd day of the postoperative period was 3.8 on the VAS scale.
Conclusion: The terminal ileum and its obstruction is the most common complication of Crohn's disease. Laparoscopic ilececal resection with the formation of a side-to-side extracorporeal ileoascendoanastomosis, in our opinion, is a safe, relatively simple and reproducible operation.
Colorectal—IBD
P064—Minimally invasive IPAA in UC
Andrea Bottari, M Cricchio, L Fortuna, C Agostini, L Vacca, F Giudici, F Cianchi
AOU Careggi, Chirurgia dell'apparato digerente, Italy
Aims: minimally invasive surgical approaches to perform restaurative total proctocolectomy in Ulcerative Colitis have been increasingly employed. In particular, the proctectomy with ileal pouch anal anastomosis (IPAA) could benefit from the robotic approach. In fact, the robotic device is potentially able to overcome both limitations found in laparoscopic and conventional open surgery. The aim of our study was to evaluate early and late postoperative and functional outcomes after IPAA, performed with open, laparoscopic and robotic techniques in UC patients.
Methods: we enrolled 386 UC patients undergoing restorative proctocolectomy with IPAA during the period 1986–2020 in a single Centre, consecutively operated either with traditional open surgery, laparoscopic or robotic techniques. We evaluate the incidence of early (within 30 days) and late (more than 30 days) postoperative complications (intestinal occlusion, haematoma/wound infection, anastomotic dehiscence), length of hospital stay and an assessment about continence, autonomic nerve damage, incidence of pouchitis and cuffitis.
Results: about the 386 patients, 333 underwent conventional open IPAA, 42 laparoscopically. and 11 robotically. Statistically different early and late postoperative surgical complications were recorded among the different surgical techniques (early and late complications respectively 22/42 and 127/333 in minimally invasive and open group). Minimally invasive surgery had better outcomes concerning wound infections (0/42), no anastomotic dehiscence, and reduced lenght of stay but open surgery showed better results on early and late intestinal occlusion (127/33) and ileo-anal anastomotic stenosis (15 /333). The incidence of cuffitis seems higher in open conventional technique than in the minimally invasive ones (46 vs 3), and within these, robotic surgery showed relatively better results than laparoscopy.
Conclusions: UC patients undergoing IPAA can benefit from a minimally invasive surgical approach, even if still limited experience are reported so far, our experience confirms that robotic approach seems to be related to promising results both in the short and long term period.
Colorectal—IBD
P065—Laparoscopic technique in the treatment of the ulcerative colitis associated colorectal carcinoma
Janos Tajti Jr. 1, M. Rutka2, K. Farkas2, S.Z. Ábrahám1, Z.S. Simonka1, A. Paszt1, T. Molnár2, G.Y. Lázár1
University of Szeged, 1Department of Surgery, 2First Department of Internal Medicine, Hungary
Aims: Ulcerative colitis (UC) associated colon tumor is a rare entity. It forms only 2% of the colorectal cancers, however it is the cause of death in 15% of the patients with UC. The cummulative probability of UC patients developing colorectal carcinoma is 2% by 10 years, 8% by 20 years and 18% by 30 years. The objective of the study is to investigate the appearance of UC associated colorectal cancer in our UC population.
Methods: Between 1 January 2003 and 30 November 2020, surgery was performed for UC associated colorectal carcinoma in 19 patients. The mean age of the patients was 56.4 years. There was an average 24.25 years from diagnosing the disease to surgery. Sixteen cases were elective interventions, while 3 were emergency surgery. Three patients did not attend gastroenterological follow-up for decades.
Results: Preoperative colonoscopy showed inflammation in 2 cases, high grade dysplasia in 3 cases, while UC associated carcinoma was described in 10 patients in the rectum and sigmoid colon, in 1 patient in the coecum, and in 3 patients in the splenic flexure. Only palliative stomas were performed with open method in the emergency cases. One ileostomy, 2 right hemicolectomies, 3 colectomies and 5 proctocolectomies with ileopouch anal anastomosis were carried out during the elective surgeries with laparoscopic technique. One exploration and 4 colectomies were performed by conventional method. There were no postoperative mortality. Postoperative histology revealed high tumor stages (T2-T4) in 15 cases. 57% of the patients had positive locoregional lymph nodes and distant metastasis like liver, lung, urinary bladder, peritoneum.
Conclusion: Considerable proportion of cases with UC associated colorectal carcinoma had undergone surgery in advanced tumor stages. The mean age of these patients were lower than in patient with sporadic colon carcinoma. UC population needs regular gastroenterological surveillance. Minimally invasive procedures can be used safely for the surgical treatment of UC associated colon tumors.
Colorectal—IBD
P066—Minimally invasive surgery for complicated Crohnʼs disease—early experience
Vasil Sotirov Kyosev1, P. Ivanov2, V. Mutafchiyski2, G. Kotashev2, K. Vasilev2, G. Grigorov2, D. Penchev2, M. Gavrilov2
Military Medical Academy, 1Endoscopic surgery, 2Clinic of Endoscopic,Endocrine surgery and Coloproctology, Bulgaria
Aims: The surgical and medical management of inflammatory bowel disease (IBD) has significantly evolved over the course of the last two decades. The evidence has been accumulating in favor of a minimally invasive approach to ileocolic Crohn’s disease (CD), especially when the disease is complicated by an abscess, a phlegmon, or fistulizing disease. This announcement presents our primary experience with three cases of complicated ileocolic CD threated with minimally invasive approach.
Methods: From October 2017 until November 2018 in our unit three consecutive patients with ileocolic Crohn’s disease complicated by a paracolic abscess, a phlegmon, or a fistula underwent minimally invasive ileocolic resection. Data recorded included demographic information, body mass index (BMI), estimated blood loss (EBL), length of surgery, rate of conversion to open surgery, length of hospital stay, and rate of complications.
Results: A total of three patients were identified. Complications from Crohn’s disease included one patient who developed a paracolic abscess that required drainage upon admission, one patient who developed a phlegmon, and one patient who developed an enteroenteric fistula. Mean age of the study population was 24 years, with a mean BMI of 22 and a mean ASA score of 2. Two (66.6%) of the patients were immunosuppressed with high-dose steroids. Mean operative time was 180 min, with a median EBL of 80 ml. Two (66.6%) patients required diversion with a loop ileostomy, there were no conversions to laparotomy. Median time to flatus was 1.6 day. All patients tolerated a diet on the day of surgery, with a median length of stay of 4 days. There were no deaths and no complications related to bleeding, organ injury, surgical site infections, or anastomotic leaks.
Conclusions: Minimally invasive surgery for complicated ileocolic Crohn’s disease can be performed safely, with short lengths of hospital stay and with a low rate of complications. A multicenter study would be beneficial to validate these findings.
Keywords: complicated ileocolic Crohnʼs disease, minimally invasive approach, ileocolic resection.
Colorectal—malignant
P067—Accelerated 23-h ERAS care for colorectal surgery (CHASE)
Thaís Tweed, Misha Sier, J.H.M.B. Stoot, J. Bastelaar, J. Nel, I. Daher, M. Bakens
Zuyderland Medical Center, Surgery, The Netherlands
Introduction: Introduction of the Enhanced Recovery After Surgery (ERAS) program has improved postoperative outcomes. The aim of this study is to evaluate the feasibility and safety of a 23-h accelerated ERAS protocol for patients undergoing colorectal surgery compared to a retrospective cohort of patients who received standard ERAS care.
Methods: This single-center, non-randomized, prospective study is currently ongoing and being conducted in a large teaching hospital in the Netherlands. Patients (≥ 18 years ≤ 80) undergoing elective laparoscopic colonic/rectal resection that meet the following criteria: BMI ≤ 35 kg/m2, WHO performance status 0, available ambulant care and contactable by phone, are eligible for inclusion. The 23-h accelerated ERAS protocol consists of a multidisciplinary and multifaceted protocol adjusting the preoperative, perioperative and postoperative care. Three main adjustments include truly minimally invasive surgery; non-opioid optimal pain management; and fluid-management. If patients meet the discharge criteria, they will be discharged within 23-h after surgery. Primary outcome is the rate of successful and safe application of the 23-h accelerated ERAS protocol for patients undergoing elective colorectal surgery.
Results: To date 53 patients were eligible for inclusion, of whom 28 patients were included in this study. Two patients were excluded; one due to conversion to an open procedure and another due to anesthesia protocol deviation. Our preliminary results show that a total of twenty-one out of 26 patients (81%) were discharged within 23 h after surgery. Six patients (23%) developed complications, of which 2 patients (8%) required a reoperation.
This studies aims to include a total of forty patients in this study. The final results will be expected soon.
Discussion This study is the first study in the Netherlands to assess the feasibility and safety of a 23-h accelerated protocol for laparoscopic colorectal surgery. It seems to be feasible and safe and this will surely lead to further reduction in the length of hospital stay.
Colorectal—malignant
P068—Drainage and presence of anastomotic leakage in colorectal Surger
Bárbara Cantarero Jimenez, IM Muñoz Nuñez, JJ Pereira Grillo, IP Plata Perez
Hospital Santa Ana, Cirugia General y del Aparato Digestivo, Spain
Objectives: To analyze the usefulness of intra-abdominal drainage after colorectal surgery in the presence of anastomotic leakage.
Material and methods: All patients who had colorectal surgery (CCR) have been studied between 01/01/2018 and 31/12/2020 analyzing the following variables: surgical technique performed, intra-abdominal drainage placement and anastomotic leak effectiveness.
Results: Of the 227 patients involved in CCR between 2018 and 2020, in 160 (72.72%) intra-abdominal drainage was placed.
Analyzing the total number of patients involved, 11 had anastomotic dehiscence. Of all the patients who had this complication, they had 72% intra-abdominal drainage. However, this was only effective in 37% of these patients, in 36% was not effective and 27% are not placed drainage.
In addition, we have analyzed the placement of intra-abdominal drainage in relation to the technique performed, obtaining its use in 31% of right hemicolectomies, 20% of left hemicolectomies, 96% of sigmoidectomies and 100% of rectum resections.
Conclusions: According to the data obtained, the need for intra-abdominal drainage placement should be assessed according to the probability of anastomotic leakage (and its relationship to surgical technique and patient characteristics), some percentage of cases drainage has not been effective, while it can provide morbidity to the patient as a delay in mobilization among others.
COLORECTAL—Malignant
P069—Management of preoperative anemia with Iron Therapy in colorectal cancer patients—a systematic review and meta-analysis
Sangara Narayanasamy1, A. Gumber2, G. Kumar3, A. Aspari4, V. Ramesh5, P. Thomas1
1Queens Hospital, Burton upon Trent, Department of General and Colorectal Surgery, 2University Hospital Wishaw, General and Colorectal Surgery, 3Royal Bolton Hospital, General and Colorectal Surgery, 4Southend University Hospital, Colorectal Surgery, 5Broomfield Hospital, Colorectal Surgery, United Kingdom
Background: Nearly half of colorectal cancer (CRC) patients are diagnosed with anemia at the initial assessment (Ferlay et al., 2015). Anemic patients require blood transfusion, which increases cancer recurrence (Acheson et al., 2012). Hence iron therapy for anemia correction reduces postoperative morbidity and mortality.
Aims: To review randomized controlled trials on iron therapy for preoperative anemia in CRC patients.
Methodology: Includes formulating a review question, analyzing, quantifying the inclusion and exclusion criteria, literature search, quality assessment, data extraction and data synthesis, bias rectification, results interpretation and summarizing the evidence. Cochrane Handbook of Systematic Reviews and acronym PICO has been used for formulating review questions and study design (O’Connor et al., 2011).
Selection Criteria: Systematic reviews and RCTs with higher level of evidence were included in this review.
Data Extraction: Quality assessment and data collection were done using PRISMA (Preferred Reporting Items for Systematic Reviews and Meta- Analysis) checklist. Data extraction and analysis done by REVMAN Manager (Higgins et al., 2011).
Results: Two trials reported that iron therapy reduces the need for blood transfusion, but with insignificant result (Table 1). All three studies showed that hemoglobin rise occurs with iron therapy postoperatively (Table 2). None of the studies analyzed the quality of life.
Table 1.
Proportion of patients who received preoperative blood transfusion

Table 2.
Haemoglobin level Postoperatively after treatment (gm/dl)

Recommendations: RCTs with larger sample size to be done for more relevant and accurate reports, aiming at the primary and secondary outcomes like morbidity, mortality and quality of life. Oral iron with fewer side effects has to be experimented for best efficacy.
Keywords: Colorectal cancer, Preoperative Anemia, Iron therapy, Postoperative complications.
Colorectal—malignant
P070—Prevention of surgical site infection after colon cancer surgery: Comparison in elective and urgent surgery
Juan José Pereira Grillo, Clara María Arrieta Martínez, B. Cantarero Jiménez, C.M. Arrieta Martínez, I. Plata Pérez
Hospital General Básico Santa Ana, Cirugía General y Digestiva, Spain
Introduction: Surgical site infection (SSI) is a common healthcare-associated infection and complicates up to 10–30% of operations with considerable strain on healthcare resources. To prevent these complications, we adopted a series of measures supported by scientific evidence and developed a prevention protocol that was established in January 2020 and is applied to patients with colorectal cancer (CRC) before and during elective colon surgery, which cannot be systematically applied in urgent surgery.
Aims: The aim of our study is to compare the incidence of SSI after elective colon surgery with respect to urgent surgery in patients with CRC, after the establishment of an infection prevention protocol in our center.
Methods: A total of 226 CRC patients underwent colon surgery since January 2018 to December 2020. In January 2020, a protocol for the prevention of SSI in CRC surgery was established, which consists of antibiotic prophylaxis before and during surgery, mechanical bowel preparation, appropriate hair removal, use of 2% chlorhexidine in alcohol skin preparation, double ring wall autoretractor, change of gloves, gown and instrumental equipment for the closure of the abdominal wall, avoidance of hypothermia and perioperative glycemic control.
Results: From January 2018 to December 2019, there were 18 of 127 patients (14.17%) with SSI after elective colon surgery and 7 of 31 patients (22.58%) after urgent colon surgery. However, since January to December 2020, there were 1 of 51 (1.96%) with SSI after elective colon surgery and 4 of 17 (23.53%) after urgent colon surgery. A decrease in SSI of approximately 12% is evidenced in elective colon surgery and a similar incidence is maintained in patients undergoing urgent surgery (Fig. 1).
Conclusions: It has been shown that prevention measures applied together and in a systematic way reduce the incidence of SSI, which allows reducing morbidity and hospital costs, therefore it is recommended to apply them in colon surgeries.
This protocol is effective in elective surgery, however, in urgent cases the patient's conditions and the impossibility of prior preparation make its application difficult and its effect is limited.
Colorectal—malignant
P071—Stop the bleeding—endoscopic management of lower-GI anastomotic hemorrhage
Florin Turcu, B. Dumbrava, C. Copaescu
Ponderas Academic Hospital, General Surgery, Romania
Aim: This study is focused on our institutional experience in the endoscopic management of postoperative bleeding in patients with lower GI anastomosis. As it is considered self-limiting, postoperative bleeding from the anastomotic site is a far less discussed complication in colorectal surgery. There are few studies to specifically address this issue. The incidence reported in the literature varies between 1–5.4%. We believe that early endoscopic hemostasis reduces the need for transfusions and length of hospital stay.
Methods: This is a retrospective study in which we have reviewed our colorectal surgery database for patients who had postoperative anastomotic site bleeding. We have measured the following parameters: the timing of bleeding after surgery, the type of anastomosis, the type of bleeding, type and number of endoscopic procedures performed.
Hemorrhage was considered when the patients had postoperative rectal bleeding.
Results: Between January 2017 and March 2021, 281 patients underwent colorectal resections with anastomosis. Of these, 18 (6.4%) experienced per rectum bleeding. The hemorrhagic episodes occurred between 2nd and 15th postoperative day (average 5.5 ± 4.5 days). Fifteen patients out of 18 (83.3%) were managed as inpatients, while 3/18 patients (16.6%) required readmission for endoscopic hemostasis.
Hemostasis was obtained in all cases (100%) as follows: in 13/18 (72.2%) patients a single endoscopic procedure was enough, while 3/18 (16.6%) required two endoscopic sessions and 1/18 (5.5%) required three sessions. The technique used was endoscopic clipping and adrenaline injection.
Based on anastomosis type, the incidence of bleeding was calculated as 7.5% for stapled circular colo-rectal anastomosis and 5.2% for stapled linear colo-colic (3.8%) and ileo-colic (6.1%) anastomosis.
Conclusions: There was a higher rate of bleeding in patients with colo-rectal circular stapled anastomosis. An active surveillance with the flexible rectoscope of the anastomotic staple line in these patients facilitates early and safe hemostasis and prevents ongoing complications.
Colorectal—malignant
P072—Triple tumour: a myriad of serial incidental findings in a patient presenting with Gallstone pancreatitis
Ashutosh Gumber1, C. Boyle1, K. Lowe1, A. Dhaif1, A. Hassan2, K. Shalli1
NHS Lanarkshire, 1Colorectal surgery, 2Gynaecology, United Kingdom
Introduction: Incidental findings on radiological investigations in patients admitted with acute abdominal problems can be significant enough to warrant further management. However, it does increase the workload on different specialities but can be rewarding for the patients. This case summary aims to present a rare case of synchronous triple tumours—colonic adenocarcinoma, endometroid ovarian adenocarcinoma, and benign brenner tumour identified in a patient admitted with acute gallstone pancreatitis. It also highlights the importance of further investigating significant unexpected findings regardless of whether they had any relevant symptoms.
Methods: A 75-year-old female presented with epigastric pain. Blood tests and USS abdomen confirmed gallstones and pancreatitis, correlating with clinical history. She was treated conservatively. USS also showed an incidental pelvic mass, which was further characterised by CT and MR scans (Figs. 1 and 2). These scans confirmed a heterogeneous lobulated mass in the left adnexa. CT scan also spotted another incidental mass in the transverse colon, confirmed as cancer by colonoscopy. She was offered therapeutic resection after discussion in Colorectal and Gynaecology MDT. Intra-operatively, transverse colon tumour was invading into the proximal ileum. Surgery concluded with laparoscopic extended right hemicolectomy, small bowel resection-anastomosis, omentectomy, hysterectomy and bilateral salpingo-oophorectomy.
Results: The patient had gradual recovery without any complications. Histopathology showed T4N2 poorly differentiated adenocarcinoma of colonic mass and FIGO grade 1 stage 1c endometrioid adenocarcinoma of left ovary. It also revealed a third incidental finding of benign brenner tumour of the right ovary. Post-operative MDT did not offer adjuvant therapy due to slow recovery and frailty. At two years’ follow-up there is no evidence of recurrence on clinical assessment and imaging, and further confirmed when she underwent laparoscopic cholecystectomy due to further attacks related to choleliethiasis.
Conclusion: This report adds to the limited literature of triple synchronous tumours, including rare Brenner accounting for 5% of benign ovarian tumours and endometrioid ovarian tumour with an incidence of 4 -7%. A multi-disciplinary approach and combined surgery can achieve a desirable outcome in such complex cases. It is crucial to act on the incidental findings and identify the tumour's primary status for guiding the treatment.

Colorectal—malignant
P073—Transanal Total Mesorectal Excision (TaTME) by TEM in low rectal cancer: results of long term follow-up (85.8 months)
Giancarlo D'Ambrosio1, A .Picchetto1, M. Guerrieri2, L. Rossi1, E. Lezoche1
1Sapienza University of Rome, Policlinico Umberto I University Hospital,, General and Colorectal Surgery Division, Department of Cardiothoracic, Vascular Surgery and Organ Transplantation, 2Polytechnic University of Marche, Hospitals of Ancona, Department of General Surgery and Surgery Methodology Clinic, Italy
Background: Since its introduction by Heald in 1982, TME is, still today, the gold standard procedure in the treatment of rectal cancer. Transanal Total Mesorectal Excision (TaTME) is a novel surgical technique to perform the mesorectal excision transanally in a bottom-up fashion.
The main advantage is to localize the distal margin of the tumor and to start the dissection from underneath. A soft or rigid platform can be utilized to perform TaTME. Aim of this study is to report the long-term results (mean follow-up 85.8 months) in patients with rectal cancer underwent TaTME by TEM.
Methods: From October 2008 to January 2015 a 22 patients’ subgroup, with low-rectal tumor underwent surgery and completed the follow up.
The mean tumor distance from anal verge was 3,6 cm (range 1 to 5).
Pathological stage was: ypT0N0 4, ypT1N0 2, ypT2N0 6, ypT2N1 2, ypT3N0 5, ypT3N1 2, ypT3N2 1.
The primary endpoints were the long-term (85.8 months) oncological outcomes, while secondary endpoint was perioperative complications.
Results: All patients completed long course n-ChRT (50.4-54 Gy) and subsequently underwent TaTME with TEM rigid platform. Ileostomy was carried out in 18 of 22 patients. CRMs were negative and mesorectal surface was good in all patients. Mean lymph node harvested was 11 (range from 8 to 23).
At mean follow up of 85.8 months, 4 patients died due to cancer related causes, 3 patients died due to unrelated causes, 1 patient presented local recurrence (underwent APR) and 3 patients distant metastases (treated with chemotherapy followed by surgery). 12 patients (54.5%) are disease free.
We experienced 5 anastomotic fistulas, 2 anastomotic stenosis, 1 recto-urethral fistula and 1 ureter injury.
Conclusion:Our oncologic results with TEM platform to perform TaTME, support this surgical approach for rectal cancer. Nevertheless, a wide experience with TEM is required to perform correctly a complete TME and reduce postoperative complications.
Colorectal—malignant
P074—Seven years results of the impact of enhanced recovery after surgery (ERAS) in older compared to younger patients undergoing colorectal surgery
Antonio D'Urso, M. Ignat, A. Lapergola, G. Mathis, F. Alexandre, D. Mutter
Hôpitaux Universitaires de Strasbourg, IRCAD, IHU,, Digestive surgery unit, France
Introduction: enhanced recovery after surgery (ERAS) can decrease complications, reduces hospital stay, and improve patient recovery. There are still controversies in the real benefit of ERAS protocol for aged patients undergoing colorectal surgery. The aim of the study was to identify any difference in term of results of ERAS protocol in older patients compared to younger ones.
Methods: retrospective analysis of the prospective maintained database of ERAS protocol of patients who underwent elective colorectal surgery between 2014 and December 2020. Patients were divided in three groups: younger than 65 years(group1), from 65 to 75 years(group2), and older than 75 years(group3). Parameters evaluated were: comorbidities, postoperative complications, leaks rate, 30 days mortality rate, intensive unit care(IUC) stay rate and length of stay (LOS), re-interventions, readmission, LOS after primary surgery, readmission and total hospitalization time(THT)(days).
Rethods: 837(524male) patients were evaluated; 415 less than 65YO; 241 between 65 and 75YO, 181 more than 75YO. Distribution of comorbidities was: diabetes 9.6%(group1), 27%(group2), 26%(group3). Cardiomyopathy: 11.3%(group1), 35,2%(group2), 49%(group3), pulmonary disease 6,5%(group1)14,9%(group2), 11,6%(group3); smoke habits 24,8%(group1), 14,5%(group2), 3,3%(group3). Complications rate were respectively 47,2%(group1),50%(group2),49,1%(group3)(p = 0.694). Anastomotic leak: 5%(group1), 4,1%(group2), 3,2%(group3)(p = 0.616). Thirty-day mortality rate was 0. IUC stay rate was: 20 days-4,8% (group1), 19 days-7,8%(group2), 12 days-6,8%(group3)(p = 0.27). ICU LOS: 0.25 ± 1.51 (0–16)(group1); 0.51 ± 2.48(0–25)(group2); 0.36 ± 2.14(0–25)(group3)(p = 0.262).LOS after primary surgery(days) was: 7.51 ± 7.85(0–56)(group1); 7.73 ± 9.94(0–98)(group2); 7.97 ± 9.73(0–112)(group3)(p = 0.06). Re-interventions were: 45 (10.8%)(group1), 25 (10,4%)(group2), 11 (6,1%)(group3)(p = 0.177). Rehospitalization: 42 (10.1%)(group1), 21 (11,6%)(group2), 16 (8,8%)(group3). Mean length of hospital stay after re-hospitalization was 5,2 days (group1), 7,7 days(group2), 11,7 days (group3) significantly different(p = 0,02). Total hospitalization time(days): 8.05 ± 8.3(0–56) (group1); 8.41 ± 10.1(0–98)(group2); 9 ± 11.1(1–112)(group3)(p < 0.006).
Conclusion: There was no significant difference in all the evaluated parameters between older and younger patients except for the total length of hospital stay and in case of readmission. Despite co-morbidities, older patients did not experience more complications. ERAS pathway is of value for all patients and does not need any adaptation for the elderly.
Colorectal—malignant
P076—After the emergence of Transanal Total Mesorectal Excision (taTME), is there still room for laparoscopic TME?
Julio Gavilán-Parras, R. Escalera-Pérez, S. MacMathuna, E. Gutiérrez-Cafranga, F. García-Molina
Hospital Jerez de la Frontera, General Surgery, Spain
B Transanal total mesorectal excision (taTME) has been in practice for ten years now. After showing promising initial results, new complications relating to damage of the urinary tract have been described. The number of patients that have undergone this treatment is still small, and the outcomes published have been realised mainly by groups highly trained in transanal surgery. We present the results from a centre with experience in laparoscopic total mesorectal excision (laTME), our goal is to demonstrate that this intervention presents acceptable results when compared to those that have been published using taTME.
Methods: Our hospital performed 282 colorectal oncological surgical interventions between 2019 and 2020, including 106 rectal resections. We excluded the cases involving superior rectal tumours, anal sphincter infiltration and those patients that had been programmed for an open intervention. We selected a cohort of 50 patients with medium and low rectal cancer that underwent laTME intervention, 62% of whom had received neoadjuvant radiotherapy. With this group we performed a descriptive study analysing the following variables: Conversion rate; Postoperative stay; Anastomotic leakage; Complications within 30 postoperative days; Acceptable oncological margins; Number of Lymph nodes harvested; and the Clavien Dindo score.
Results: Two interventions (4%) required conversion. The mean postoperative stay was 9.5 days (SD 8.1). There were four cases of anastomotic leakage (8%), 18 patients (36%) suffered at least one postoperative complication. Only one patient (2%) had non-acceptable oncological margins and the mean number of lymph nodes harvested was 10.1 (SD: 6). Six patients (12%) scored III according to the Clavien Dindo classification, with no patient scoring IV or V.
Conclusion: These results show that laTME still remains a secure and acceptable technique to perform an anterior rectal resection. TaTME may bring some advantages such as greater harvesting of lymph nodes, and a reduction in surgical time when two teams work simultaneously. However, we must consider that taTME, is still in its early stages and time and further evaluation will be needed to compare the two approaches.
Colorectal—malignant
P077—Intra-corporeal versus extra-corporeal anastomosis after laparoscopic right colectomy: an Individual Patiet Data pooled-analysis of randomized trials
Carlo Alberto Ammirati1, A. Arezzo1, M.E. Allaix1, J. Bollo3, E. Targarona3, A. Vignali4, R. Rosati4, R. Passera2, M. Morino1
Città della Salute e della Scienza, 1Department of Surgical Sciences, 2Division of Nuclear Medicine University of Torino, Italy. 3Hospital de la Santa Creu i Sant Pau, Department of Medicine of the Autonomous University of Barcelona, Spain. 4San Raffaele Scientific Institute, Department of Gastrointestinal Surgery -Milan, Italy
Purpose: The right hemicolectomy technique with ICA has gradually taken off, despite an evident greater difficulty, without any demonstration of benefit compared to the ECA technique. This study aims to compare right hemicolectomy techniques with intracorporeal anastomosis (ICA) and laparo-assisted extra-corporeal anastomosis (ECA).
Methods: We performed an Individual Patient Data Pooled-Analysis (IPD-PA) of randomized controlled trials (RCTs) up to July 1st, 2020, comparing ICA and ECA in laparoscopic right colectomy. We evaluated any differences during the postoperative clinical course in terms of Length Of Stay (LOS), anastomotic leakage, postoperative paralytic ileus and 30-days readmission.
Results: We included three RCTs enrolling 340 patients. Overall median LOS was 6 days (range 2–38) in the ECA group and 5 days (range 2–42) in the ICA group (p = 0.210). The median operative time value was 121 min in the ECA group and 145 min in the ICA group (p < 0.001). The ICA technique was associated with a shorter skin incision (6.5 vs 8 cm, p < 0.001), less pain at postoperative day 4 th (p = 0.013), lower incidence of postoperative ileus (7.7% vs 17.5%, p = 0.006) and hospital readmission (1.5% vs 2.9%, p = 0.04). No significant difference was observed in terms of the postoperative clinical course assessed with Clavien-Dindo classification.
Conclusions: No significant difference was observed between the two groups in terms of LOS, while ICA demonstrated a benefit in shorter skin incision, postoperative pain, ileus and readmission. Further data are necessary to understand what reconstruction technique to prefer after laparoscopic right colectomy.
Colorectal—malignant
P078—Has the covid 19 pandemic adversely affected the outcome of colorectal cancer in a district general hospital in Southwest England?
Ngozi Anyaugo, M. Hanna, A. Al-Alqaileh
Weston general hospital, General surgery, United Kingdom
Aims: The first wave of the COVID 19 pandemic resulted in a myriad of events including suspension of elective colorectal services across NHS trusts in the UK including cancer surgeries. It is thought that this would adversely affect patient outcomes. This study aimed to objectively assess this assumption by comparing data from before the pandemic and data collected throughout 1 year from the first national lockdown in a general hospital.
Methods: Two sets of retrospective data were collected from a prospectively maintained database. The timelines compared were 1 year from before the pandemic (January 2019 to December 2019) and 1 year of data during the pandemic (march 2020 to march 2021). Data on demographics, timing from referral to date of definitive treatment, waiting times, operation types and pathologic staging of disease were compared between the 2 periods. The incidence of advanced disease using the Duke staging was compared in the 2 cohorts.
Results: A total number of 53 cases were identified in period 1 and only 32 cases in period 2. In terms of the waiting times, the median number of days from first referral to definitive treatment was 75 in period 1 and 98.5 in period 2. The median number of days from decision to operate to date of operation was 18 in period 1 and 27 in period 2. The proportion of open resections in period 2 was more than period 1 with 33% of procedures done laparoscopically. This was a significant drop from 62% in the preCOVID period. The proportion of advanced disease (Duke’s C and metastatic) was 45.3% in period 1 and 40.63% in period 2.
Conclusion: The hospital did not meet national target of 85% (Patients should receive definitive cancer treatment within 62 days of GP referral) on both periods, with significantly longer waiting times and fewer surgeries during the pandemic. Interestingly, there has been no difference in the pathologic staging results following surgery. However, the full effects of these delays cannot be fully assessed at this time and would require a larger sample size/ re-audit in 1 or 2 years to determine the 2–5 year mortality.
Colorectal—malignant
P079—Laparoscopic 2D vs 3D colectomy; Our experience and review of the literature
Margarita Karageorgou1, A Gklavas1, S Akakiou1, D Myoteri2, D Dellaportas1, T Theodosopoulos1, A Polydorou1
Aretaieion University Hospital, 12nd Department of Surgery, 2Department of Pathology, Greece
Aims: In the era of minimally invasive techniques laparoscopy has seen great advances especially in the area of new 3D laparoscopes. It is stated in the literature that classic 2D laparoscopy does not offer the stereoscopic perception of the surgical field, which results in the surgeon’s better orientation and co-ordination of complex tasks, thus reducing the time of the operation and promoting patient safety.
Methods: A single-centre, retrospective study is presented in order to compare laparoscopic 2D versus 3D elective colectomies. The data included 87 patients that underwent laparoscopic colectomies performed between January 2017 and March 2019 by six experienced surgeons and were divided in two main categories (2D vs 3D) and subdivided in four categories according to the type of the operation (right or left colectomy and lower anterior resection) [Tables 2 and 3]. The protocol followed for the operative technique was that of total mesorectal excision for rectal cancer and of total mesocolic excision for colonic cancer.
Table 2.
.

Table 3.
Comparison of outcomes of 2D and 3D colectomies
| Characteristics |
Right colectomy
(n = 30) |
Left colectomy
(n = 28) |
Low anterior resection
(n = 25) |
|||||||
|---|---|---|---|---|---|---|---|---|---|---|
| 2D (n = 15) |
3D (n = 15) |
P | 2D (n = 13) |
3D (n = 15) |
P | 2D (n = 12) |
3D (n = 13) |
|||
| Time (min), median (IQR) | 130 (100–180) | 120 (120–180) | 0.90 | 150 (137–200) | 180 (120–240) | 0.71 | 210 (192–255) | 185 (140–230) | 0.16 | |
| Conversion, n (%) | 3 (20.0) | 4 (26.7) | 1.00 | 4 (30.8) | 3 (20.0) | 0.67 | 3 (25.0) | 1 (7.7) | 0.32 | |
| Hospital stay (days), median (IQR) | 4 (3–7) | 7 (4–8) | 0.32 | 4 (4–7) | 6 (4–8) | 0.47 | 6 (4.3–9.8) | 6 (5–7.5) | 0.72 | |
| Refeeding, median (IQR) | 2 (1–3) | 3 (1–4) | 0.16 | 1 (1–3.5) | 2 (1–3) | 0.46 | 2 (1–3) | 3 (1–3) | 0.65 | |
| Blood transfusion, n (%) | 0 (0.0) | 3 (21.4) | 1.00 | 2 (15.4) | 4 (26.7) | 0.65 | 1 (8.3) | 3 (23.1) | 0.59 | |
| 30-day complications, n (%) | 3 (20.0) | 4 (26.7) | 1.0 | 3 (23.1) | 3 (20.0) | 1.0 | 2 (16.7) | 1 (7.7) | 0.5 | |
| -Clavien-Dindo I | 2 (13.3) | 3 (20.0) | 0 | 2 (15.4) | 2 (13.3) | 0 | 0 (0.0) | 1 (7.7) | 9 | |
| II | 1 (6.7) | 1 (6.7) | 0.8 | 0 (0.0) | 1 (6.7) | 0.5 | 2 (16.7) | 0 (0.0) | 0.2 | |
| III | 0 (0.0) | (0.0) | 8 | 0 (0.0) | 0 (0.0) | 6 | 0 (0.0) | 0 (0.0) | 1 | |
| IV | 0 (0.0) | 0 (0.0) | 0 (0.0) | 0 (0.0) | 0 (0.0) | 0 (0.0) | ||||
| V | 0 (0.0) | 0 (0.0) | 1 (7.7) | 0 (0.0) | 0 (0.0) | 0 (0.0) | ||||
| Oncological outcomes | (n = 15) | (n = 14) | (n = 8) | (n = 12) | (n = 12) | (n = 12) | ||||
| - Positive margins, n (%) | 3 (20.0) | 0 (0.0) | 0.22 | 1 (12.5) | 1 (8.3)1 | 1.00 | 0 (0.0) | 1 (10.0) | 0.46 | |
| - Harvested LNs, median (IQR) | 20 (19–25) | 22 (19–24) | 0.64 | 14 (12–21) | 8 (14–24) | 0.26 | 15 (13–26) | 17 (15–19) | 0.35 | |
N number, IQR interquartile range, LNs lymph nodes
Results: All P-values were 2-sided, and values < 0.05 were considered statistically significant. All calculations were performed using the SPSS version 23.0 software (SPSS, Chicago, IL). No statistically significant findings are reported in this study. This could be due to the small number in each subcategory and the multiplicity of surgeons.
Conclusions: In order to establish a significantly important statistical difference more randomised control trials and larger studies are required. This study did not show any significant difference between 2 and 3D colectomy.
Keywords: Colorectal cancer, colectomy, laparoscopy, 2D, 3D, laparoscopic colectomy, review.
Colorectal—malignant
P080—Management of the intra-pelvic abscess after total pelvic exenteration for locally advanced rectal cancer with adjacent organs invasion
Tatsuya Kinjo, Y. Miyagi, S. Ishino, F. Kawamata, S. Ohno, H. Karimata, H. Shimoji, M. Takatsuki
University of the Ryukyus, Department of Digestive and General Surgery, Japan
Background: The frequency of complications after total pelvic exenteration (TPE) for locally advanced rectal cancer is high, and intra-pelvic abscess sometimes develops severe situations. We started the TPE with anal preservation, including anastomosis or perineal reconstruction using myocutaneous flap for intra-pelvic dead space from 2016. Objectives: The aim of this study was to evaluate the significance of our management of intra-pelvic abscess for TPE for locally advanced rectal cancer. For intra-pelvic dead space, we performed the following procedures: 1st choice: Anal preservation with anastomosis, 2nd choice: Myocutous flap reconstruction.
Patients: Nine patients with rectal cancer who underwent TPE at our institution from April 2009 to March 2019 were included was dived into two following groups: Pre-2016 group (2009–2015) 4 patients, Post-2016 group (2016–2019) 5 patients. Results: In Post-2016 Group, CEA (p = 0.04) and CA19-9 (p = 0.006) were significantly elevated (p = 0.04, p = 0.006, respectively). In the Pre-2016 group, 2 recurrence patients and sacrectomy on 3 patients, anal preserve without anastomosis on 1 patient, and 1 patient on ometoplasty were included. In Post-2016 group, laparoscopic surgery on 3 patients, anal preservation with anastomosis on 3 patients, and myocutatneous flap on 2 patients were included. Short-term outcomes: Hospital stay in Post-2016 group was significantly shorter than in Pre-2016 group (p = 0.01). Grade 3 and more than Grade 3 complications were found in Pre-2016 group, e.g. intra-abdominal abscess and/or intra-pelvic abscess in 2 patients developing intraabdominal bleeding to need surgical stasis. Case Presentation: 64-year-old, male with tarry stool, bodyweight loss, fecaluria was referred to our hospital because of rectal cancer (Rsa) invading the urinary bladder, and underwent four cycles of SOX + Bmab as neoadjuvant chemotherapy after a transverse colostomy. He refused to undergo surgery because fecaluria disappeared, but he decided to undergo surgery after he had fecaluria again. Preoperative imaging showed re-growth, tumors occupying nearly the whole pelvis. Laparoscopically TPE was performed with anal preservation with anastomosis for preservation of intra-pelvic infection. Post-operative course was good without Grade 1 fever. Conclusion: Anal preservation with anastomosis and perineal reconstruction using myocutaneous flap could be useful for prevention of the intra-pelvic abscess after TPE.
Colorectal—malignant
P081—Study of positive pathological node metastasis in patients with selective lateral node dissection for lower RC after peroperative chemoradiotherapy
Ryo Okamoto, H Yanagi, Y Nakamoto, N Ichise, G Matsuki
Meiwa Hospital, Depertment of Surgery, Japan
Introduction: It is known that local control can be obtained by performing preoperative chemoradiotherapy (CRT) for locally advanced lower rectal cancer(LRC), but there are cases in which lymph node metastasis remains even after CRT.
We investigated lymph node metastasis-positive cases among those who underwent preoperative CRT + selective lateral dissection(LLND) for advanced LRC performed at our hospital.
Methods: From 2012 to 2019, we examined the treatment results of presence or absence of dissection lymph node metastasis and the outcome of treatment such as 3-year- local relapse free survival rate/all recurrence free survival rate/overall survival rate(LFS / RFS / OS) for LRC combined with CRT + lateral dissection.In our institute, patients with advanced LRC undergo short CRT (total 25 Gy in 10 fractions) with S-1 or Capecitabine.The lateral lymph nodes detected more than 6 mm in a short diameter by pretreatment magnetic resonance imaging (MRI) are diagnosed as metastasis.and selective LLND is performed.
Results: LLND was performed in 50 indicated cases. Pathological findings showed a negative rate of posterior lateral metastasis of CRT of 80%, positive mesenteric metastasis in 12 cases, positive lateral metastasis in 10 cases, and 7 of them had mesenteric and lateral metastasis. Excluding Stage IV cases,3 year- LFS / RFS / OS was 87.5% / 70.5% / 91.7%, and lateral lymph node metastasis recurrence was only in 1 case on the non-dissected side.
In the group that was negative for both the mesentery and lateral.
3 year-LFS / RFS / OS: 93.3% / 78.0% / 87.7%, whichever was positive was 100% / 52% / 80%, whereas in 7 cases where both mesentery and lateral were positive, 6 In some cases, metastasis and recurrence occurred within 6 months, and only one survived, and the prognosis was worse than that of stage IV cases.
Conclusion: Although good results have been obtained by our strategy, better treatments should be considered for the patients with residual both mesentery and lateral lymph node metastasis.
Colorectal—malignant
P082—No difference in quality of complete mesocolic rezection after open and laparoscopic colonic resection for cancer
Vasile Bintintan1, V. Fagarasan2, D. Andras1, G. George1, C Constantin1
1University of Medicine, Clinica Chirurgie I, Cluj Napoca, 2Spitalul Clinic, Clinica Chirurgie I, Judetean Cluj, Romania
Introduction: The concept of complete mesocolonic excision (CME) is accepted as valuable but still is not implemented worldwide as the standard of care for colonic cancer. Laparoscopic resection of the colon is nowadays widespread but quite often does not fulfill the criteria for a complete mesocolonic resection. The aim of this paper is to analyze comparatively the results of open vs laparoscopic resection of colonic cancer when performed by a surgical group focused on complete mesocolonic resection.
Method: Clinical data from patients with colon cancer who underwent open or laparoscopic CME at the 1st Surgical Clinic Cluj Napoca, Romania by the same surgical group between January 2012 to June 2020 was analyzed. All procedures were performed using a medial-to-lateral primary vascular control technique respecting all requirements of a complete CME.
Results: 100 patients fulfilled the inclusion criteria of which 61 were operated using an open and 39 a laparoscopic approach. Left, right and transverse colectomies were performed in 47%, 41% respectively 12% of cases. The complete resection rate (R0, p = 0.24) length of distal resection margin (p = 0.56), proximal resection margin (p = 0.15), radial resection margin (p = 0.41) and lymph node count (p = 0.488) were similar between open and laparoscopic groups. Tumor size was the only significantly different parameter and was higher in the open group (5 vs 4 cm, p = 0.05). The same results were obtained also in the advanced stage III and pT3 cancers subgroups. There were no differences in the postoperative outome regarding mortality, morbidity, reintervention rate and hospital stay.
Conclusion: Laparoscopic colectomy is a safe option for patients with colon adenocarcinoma in hands of experienced surgical surgeons while complete resection, safe resection margins and proper lymph node dissection can be achieved through a minimally invasive approach respecting principles of complete mesocolic excision with safe outcomes even in locally advanced tumors.
Colorectal—malignant
P084—Transanal endoscopic operation (TEO): a valid alternative for rectal lesion excision from a single Italian center
Carlotta Agostini, G. Barbato, L. Fortuna, A. Bottari, F. Cianchi, F. Coratti
AOU Careggi, Chirurgia apparato digerente, Italy
Aims: Nowadays, transanal surgery for the removal of benign tumors and low-risk T1 carcinomas of the rectum has become a valid alternative approach. Significant benefits in terms of morbidity and mortality are confirmed. There are multiple platforms for transanal surgery but the Transanal Endoscopic Operation (TEO) system® is one of the best known, is an effective option for transanal complex procedures with all the advantages of minimally invasive surgery.
Methods: Between September 2018 and October 2020, 25 patients with rectal lesions suitable to transanal treatment came to our observation. In all reported cases, full-thickness rectal resections were performed. Demographic,histopathological, surgical morbidity/mortality and clinical outcome in all patients who underwent TEO were retrospectively evaluated from a prospectively collected database. A rectal insufflation of 20 mmHg is set and laparoscopic instruments are used. This method ensures precise surgery with magnified vision. Full-thickness ultrasound guided dissection of tumor was performed circumferentially on the anterior wall preserving the surrounding structures, avoiding iatrogenic anal sphincter lesions. At the end of the procedure, hemostasis is performed with V-Loc sutures and the defect is closed. The space constraints in the pelvis makes optimal oncological surgery demanding and the proximity to the anal sphincter enhances the potential morbidity of any radical surgery.
Resuls: For a period of less than 2 years, 25 rectal lesions were excised by TEO. 16 lesions (64%) were low (< 4 cm), 7 (28%) were mid-rectal (4–8 cm) and 2 (8%) were in the proximal rectum (> 8 cm). There was no 90-day mortality. Postoperative complications included: 3 (12%) bleedings, managed conservatively without blood transfusions; 8 (32%) post-polypectomy syndrome, managed with an extended course of antibiotics.
Conclusions: Our initial experience suggests that TEO is safe because full-thickness excision ensures adequate deep margins. It has the benefit of minimal morbidity and sphincter preservation with oncological radicality. TEO is a feasible and safe method for the removal of local carcinomas of the rectum. However, this procedure may be reserved for experienced surgeons, only in adequate reference centers.
Colorectal—malignant
P085—Colonoscopy in the elderly: a single centre Nigerian experience
Emeka Ray-Offor1, N. Jebbin2
1Oak Endoscopy Centre / University of Port Harcourt Teaching Hospital, Digestive Disease Unit, Nigeria 2University of Port Harcourt Teaching Hospital, Surgery Department, Nigeria
Background: Elderly patients are at risk of inadequate bowel preparations for colonoscopy due to poor compliance, certain patient related medications and comorbidities. Hence more complications are related to colonoscopy in elderly patients, either directly or indirectly.
Aim: To study the outcome of colonoscopy in patients aged 65 years and above from a Nigerian metropolis in sub-Saharan Africa.
Patients and method: A cohort study of consecutive patients undergoing colonoscopy in a referral multi-disciplinary endoscopy facility in Port Harcourt metropolis, Niger delta Nigeria from March 2014 to November 2020.The variables collated were age, gender, literacy level, colonoscopy indications, medical history, bowel preparation agent and outcome. Statistical analysis was performed using SPSS version 25.
Results: Of 547 colonoscopies performed during study period 19.9% (i.e., 109) were performed in patients aged 65 years and above (mean age 73.0 ± 6.0 years). A post-secondary educational level was recorded in 47(43.1%) patients with comorbidities in 65 (59.6%) predominantly: hypertension (HTN)- 47; diabetes mellitus (DM)-4; and HTN/DM- 14. Inadequate bowel preparation was seen in 41(37.6%) with 3 cancelled procedures. A lower caecal intubation rate (80.7 vs 92.3%; p < 0.01) was recorded with no direct complication from procedures but for transient abdominal cramps.
Conclusion: In our environment, colonoscopy is feasible and safe in the elderly when indicated but an intensified bowel preparation protocol is needed in this group of patients for optimal outcome.
Colorectal—malignant
P086—The usefulness of ICG fluorescence imaging in left-sided colorectal cancer surgery and risk factors associated with decreased intestinal blood flow
Yuki Adachi1, T. Shonaka1, C. Tani1, T. Takeda1, M. Otani1, W. Matsushita1, K. Hasegawa2, N. Matsuno2, H. Furukawa1, Y. Sumi1
Asahikawa Medical University, 1Division of Gastrointestinal Surgery, 2Division of Hepatobiliary Transplantation Surgery, Japan
Aims: Anastomotic leakage is an important complication in left-sided colorectal cancer surgery. One of the risk factors for anastomotic leakage is the poor blood supply to the intestine. The purpose of this study was to evaluate blood flow using ICG fluorescence imaging and to identify risk factors for inadequate intestinal perfusion.
Methods: This was a single-center, retrospective study of patients who underwent laparoscopic left-sided colorectal cancer surgery at our hospital from June to November 2020. We excluded cases of emergent surgery and multiple primary cancers. After distal transection of the intestine, the proximal transection line was determined based on findings such as arterial pulse. the intestinal perfusion was evaluated by ICG fluorescence, and if blood flow was inadequate, the dissection line was changed. The patients were divided into two groups according to whether or not the line was changed, and the differences in patient profiles and surgical factors between the two groups were examined retrospectively. The association between intestinal blood flow and various factors was statistically analyzed using Fisher's exact test.
Results: Twenty-seven patients were included in the study, of which 7 (25.9%) changed the proximal transection line. The mean change in distance was 2.7 cm (median: 2 cm [1.0–5.0 cm]) proximally. Statistical analysis revealed that significantly more patients with advanced TNM classification had a change of the proximal transection line (UICC-TNM stage I-II: 1/14, stageIII-IV: 6/13 [P = 0.033]). Anastomotic leakage was observed only in one patient who did not change the line of transection, and not in the group who changed it.
Conclusions: ICG fluorescence imaging is an objective measure to evaluate intestinal blood flow and is useful in determining the transection line. Advanced TNM classification may be a risk factor for decreased intestinal blood flow.
Colorectal—malignant
P087—IMPACT OF LAPAROSCOPIC COLORECTAL SURGERY ON BODY IMAGE
Alba Fernández-Candela, Luis Sánchez-Guillén, C. Curtis Martínez, M. Bosch Ramírez, D. Triguero Cánovas, S. Lario Perez, C. Lillo García, A. Sanchis López, A. Soler Silva, C. López de Lerma Martínez de Carneros, S. Quinto Llopis, A. Arroyo Sebastián
Hospital General Universitario de Elche, Cirugía General, Spain
Aims: The aim of this study is to evaluate the impact of laparoscopic colorectal surgery, comparing its different approaches, on body image using the validated Body Image Scale (BIS) as a parameter of surgical quality.
Methods: We conducted an observational descriptive study. Patients who underwent scheduled laparoscopic colorectal surgery between June 2015 and December 2019 by the Coloproctology Unit of Elche´s University Hospital were included.
Results: The sample included 180 patients, 115 men (63.9%) and 65 women (36.1%) with a median age of 67 years. Most of the patients were operated due to malignant pathology (98.8%). There were 57 right hemicolectomies (31.7%), 51 sigmoidectomies (28.3%), 37 anterior resections (20.6%), 18 left hemicolectomies (10%), 8 ultra-low anterior resections (4.4%), 5 subtotal colectomies (2.8%) and 3 segmental resections (1.7%). A stoma was required in 16 surgeries (8.9%). In most patients, a suprapubic (69.4%) or transverse (19.4%) incision was made. 21.9% suffered some type of postoperative complication: 13.9% had surgical wound complication and 10.6% presented incisional hernia.
The general result of the BIS questionnaire was satisfactory, with a median of 0 in the responses (no alteration of body image). When analyzing the results according to sex, statistically significant differences were obtained: 46.2% of the women had some alteration in body image, compared to 28.7% of the men (p = 0.018). Regarding the type of surgery, low and ultra-low anterior resection were the ones that obtained the worst scores, with 13,5% and 12,5% respectively of patients with a BIS score above 5 (p = 0.044). Patients with a stoma obtained worst punctuation (25% above 5 vs 6,1%, p = 0.001). No statistically significant differences were found regarding the type of incision. Also, patients with complications (wound infection or incisional hernia) and with anxiety or depression history did not obtain worse results.
Conclusion: The study results show that in general, patients undergoing laparoscopic colorectal surgery have a good post-surgical body image. However, patients with stoma and women were more dissatisfied with their body image. It should be emphasized that there is no worse body image due to the type of laparotomic incision, so the least iatrogenic one should be recommended.
Colorectal—malignant
P088—Surgical Outcomes of CROSS0 and Other Groups in Obstructive Colorectal Cancer after Stenting
Tomihiro Takeda1, T. Shonaka1, C. Tani1, R. Shimazaki1, Y. Adachi1, M. Otani1, W. Matsushita1, K. Hasegawa1, N. Mastuno2, H. Furukawa2, Y. Sumi1
Asahikawa Medical University, 1Division of gastrointestinal surgery, 2Division of hepatobiliary transplantation surgery, Japan
Objective: To elucidate the characteristics and short-term outcomes of patients who underwent radical surgery for obstructive colorectal cancer after stenting.
Subjects and methods: 51 patients who underwent surgery after stenting for obstructive colorectal cancer in our department between March 2016 and September 2020 were included. The participants were divided into two groups according to the ColoRectal Obstruction Scoring System (CROSS) prior to stent placement. Group A with CROSS0 (11 cases) and group B with CROSS1-4 (40 cases) was compared by statistical analyses using Fisher's exact test for categorical variable values and Mann–Whitney U test for continuous variable values. EZR was used for all statistical analyses, and a two-sided p-value of P < 0.05 was considered statistically significant.
Results: The median age was 74.5 (54–82) years in group A and 71 (57–95) years in group B (P = 0.57). Gender was 8 males and 3 females in group A and 21 males and 19 females in group B (P = 0.31). There was one stent complication in group A (9.1%) and six complications in group B (15%) (P = 1). The median operative time was 221 (133–459) minutes in group A and 289 (160–735) minutes in group B (P = 0.31). Blood loss was 61 (0–657) ml in group A and 15 (0–1188) ml in group B (P = 0.37). Postoperative complications occurred 2 cases (18.2%) in group A and 11 cases (27.5%) in group B (P = 0.71). The median postoperative hospital stay was 12 (7–62) days in group A and 12 (7–63) days in group B (P = 0.94). The median observation period was 342 (34–1293) days in group A and 197.5 (21–1395) days in group B (P = 0.26). Tumor localization (A:T:D:S:RS:Ra) was 3:4:2:2:0:0 cases in group A and 3:7:4:11:12:3 cases in group B (P = 0.07). The depth (T3:T4a:T4b) was 5:5:1 in group A and 23:13:4 in group B (P = 0.79). Surgical debridement surface was positive in 3 cases (27.3%) in group A and 1 case (2.5%) in group B (P = 0.03).
Conclusion: In this study, we found significant cancer cell infiltration on the surgical debulking surface in the CORSS0 group, suggesting that special attention is required during dissection on the surgical debulking surface for CROSS0 group after stenting.
Colorectal—malignant
P089—Robotic assisted right colectomy versus laparoscopic approach
Case matched study and cost effectiveness analysis
Valentina Ferri1, E. Vicente1, Y. Quijano1, H. Duran1, E. Diaz1, I. Fabra1, L. Malave1, P Ruiz1, V. Nola, G. De Nobili, R. Caruso1
1Hm Sanchinarro University Hospital, General Surgery, 2Policlinico San Matteo Pavia, General Surgery, 3Univerista Di Chieti, General Surgery, Italy
Aim: The aim of this study is to compare clinical and oncological outcomes of Robot-Assisted Right Colectomy with those of conventional Laparoscopy-Assisted Right-Colectomy, reporting, for the first time in literature, a cost effectiveness analysis.
Methods: This is an observational, case matched prospective non-randomized study conducted from October 2015 to October 2018 at Sanchinarro University Hospital, Madrid. Patients with?right-sided colonic cancer were treated with Robot-Assisted Right Colectomy and a propensity score matched (1:1) was used to balance preoperative characteristics of a laparoscopic control group. Perioperative, postoperative, long-term oncological results and costs were analysed, and quality adjusted life years (QALY), and the cost-effectiveness ratio (ICER) were calculated. The primary end-point was to compare the cost-effectiveness differences between both groups. A willingness-to-pay of 20,000 and 30,000 per QALY was used as a threshold to recognize which treatment was most cost effective.
Results Thirty-five Robot-Assisted Right Colectomy were included and a group of 35 Laparoscopy-Assisted Right Colectomy was selected. Compared with the laparoscopic group, the robotic group was associated with longer operation times (343 min vs. 179 min, P < 0.001). No significant difference was observed in terms of total costs between the robotic and laparoscopic groups (9,455.14 vs 8,227.50 respectively, p = 0.21). At a willingness-to-pay threshold of 20,000 and 30,000, there was a 78.78% to 95.04% probability that the robotic group was cost effective relative to laparoscopic group.
Conclusion Robot-Assisted Right Colectomy is a safe and feasible technique and is a cost effective procedure.
Colorectal—malignant
P090—Intraoperative study of perfusion in colon surgery using ICG—early experience
Stylianos Kapiris, M. Sotiropoulou, P .Alexakou, N. Ntargakis, M. Psarologos, P. Metaxas, H. Kyzeridis, D. Stergiou, E. Kefalou, E. Mavrodimitraki, M. Kazantzi, S. Kapiris, A. Kolinioti, I. Alevizakis
"EVANGELISMOS" Hospital, 3rd Department of Surgery, Greece
Aim: Anastomotic leakage after colon surgery is a serious complication, with increased mortality and morbidity. The reported incidence is 3–20%. In recent years, intraoperative imaging with indocyanine green has gained ground as a method for assessing blood flow. The purpose of our study is to contribute scientific data in the field of surgery.
Methods: We present 52 cases in which indocyanine green dye (ICG) was used intraoperatively.
33 laparoscopic left colectomies, 8 laparoscopic right colectomies, 8 left colectomies and 3 right colectomies were performed. The protocol used involves the administration of 0.3 mg / kg indocyanine intravenously by the anesthesiologist, immediately after ligation of the intestinal vessels and exclusion of the affected part, but before the completion of the anastomosis, Fig. 1. After 2–3 min and the use of a laparoscopic tower and IR camera, the intraoperative blood flow to the proximal and distal part of the intestine is assessed, using infrared light, Fig. 2.
Results: In all cases so far fluorescence has lasted at least 60 s and perspiration has been defined as adequate in all right colectomies. Ιn 3 cases of laparoscopic left colectomy an additional part of the intestine had to be dissected to ensure adequate perfusion. In all cases anastomosis has followed and the patients have a good postoperative course without complications.
Conclusion: Indocyanine angiography seems from our first results to be a safe and useful technique in order to reduce anastomotic leaks in bowel surgery to reduce morbidity and mortality in these patients. The application of the protocol continues in our clinic, so that with a larger number of patients we can provide new data.
Colorectal—malignant
P091—Surgical site infection after Colon surgery: Analysis of a care bundle as a method of infection prevention in a regional hospital
Isabel María Muñoz Núñez, I. Plata Pérez, C. Arrieta Martínez, P. Vázquez Barros
Hospital Santa Ana Motril, Cirugía General, Spain
Aims: The aim of this study is to evaluate how Surgical Site infection (SSI) in colon surgery can be reduced by using an infection prevention care bundle called IQZ (Zero Surgical infection) in its Spanish acronym.
Methods: A number of 369 patients underwent colon operations since January 2016 to December 2020. IQZ was introduced in June 2019 in order to reduce SSI. This bundle consists of prophylactic antimicrobial agent within 24 h of surgery (Metronidazole and Neomycin via oral; Cefuroxime and Metronidazole intravenous), mechanical bowel preparation, use of alcoholic chlorhexidine, double ring wall autoretractor, among others.
Results: There are 33 patients (9% approx.) with SSI after colon surgery since 2016 to 2020, taking into consideration both, open and laparoscopic approaches (22 in open surgery and 11 in laparoscopic surgery). Before IQZ, there were 30 of 242 patients (12.40%) with SSI after colon surgery (20 laparotomy, 10 laparoscopy). However, since June 2019 to December 2020, there were 127 colon surgeries but only 3 cases with SSI (2.36%). As a result we can observe that SSI has decreased approx. 10% since the application of IQZ.
Conclusion (s): It has been proved by recent researches that infection prevention care bundles are useful to prevent SSI because the number of SSI has been decreased in a significant way. Consequently, avoiding SSI led to reduce morbidity and costs associated with SSI. For that reason, care bundles should be used in colon surgeries.
Colorectal—malignant
P092—Transanal total mesorectal excision (TaTME)- initial experience
Stefan Tudor, C. Minciuna, D. Gavrila, M. Lacatus, S. Manciu, C. Vasilescu
Fundeni Clinical Institute, General Surgery, Romania
Transanal total mesorectal excision (TaTME) was first introduced in 2010. Even though it represents a relatively new approach in the surgical treatment of colorectal cancer, further studies are needed to confirm its superiority over the laparoscopic total mesorectal excision. In Romania, the first case was performed in April 2019. We present the initial experience of our center. Since then, two more patients had undergone TaTME. The surgical team took into consideration the patient’s characteristics and the tumor features and decided to use the transanal total mesorectal excision technique. The surgical technique (Figs. 1 and 2) and possible problems were presented, including postoperative complications and oncological issues. Patient selection and extensive experience in minimally invasive colorectal surgery consists the foundation of a good technique implementation.

Colorectal—malignant
P093—Indocyanine green as a verification method for colo-rectal anastomoses. Our case series
Antonio Gila Bohórquez, J. Gómez Menchero, P. De La Herranz Guerrero, J.M. Suárez Grau, J.l. Guerrero Ramírez
General Hospital Of Minas De Riotinto, Surgery, Spain
Introduction: The evaluation of perfusion in colo-rectal anastomoses is still a field of study and progress for the development of new modalities that allow reducing the ratio of dehiscence or anastomotic leakage (AL) in said surgery. Our objective with this work is to highlight the utility of indocyanine green (ICG) in the said evaluation after colo-rectal surgery.
Methods: We present a series of 97 cases of colorectal surgery (benign and malignant disease) intervened in the period between 2014 and 2020. The population sample has been homogenized according to age criteria, risk factors and comorbidity. A retrospective database has been developed with the SPSS v.22 software for the evaluation of the results obtained. The primary outcome measure was AL rate with at least 1 month of follow-up.
Results: A significant reduction in the incidence of AL was observed in patients who underwent colo-rectal surgery (p = 0.005). Low AL rates were shown in rectal cancer surgery (p = 0.02). There was no significant decrease in the AL rate when colorectal procedures for benign and malignant disease were combined.
Conclusions: The use of the image by fluorescence with indocyanine green is a safe, reproducible and relatively simple method with which to evaluate the perfusion of the colorectal anastomosis as well as reduce the rate of anastomotic leak in the postoperative period. Large well-designed randomized control trials are needed to provide evidence for its routine use in colorectal surgery.
Colorectal—malignant
P094—TaTME reduce systemic inflammatory response in comparison to standard laparoscopic TME. Prospective analysis of inflammatory markers
Mateusz Wierdak, M. A. Pisarska-Adamczyk, M. Wysocki, M. Rubinkiewicz, P. Major, A. Faber, I. Karpinska, M. Pedziwiatr
Jagiellonian University Medical College, 2nd Department of Surgery, Poland
Aims: We performed a prospective case-matched study to assess the difference in systemic inflammatory markers response after TaTME and laparoscopic TME of the rectum, in the group of patients operated for rectal cancer without infectious complications.
Methods: Prospective, case-matched study was conducted between January 2014 and December 2019. All patients operated in our department for the rectal cancer were enrolled. Blood samples were gathered on 1,2 and 3 postoperative day (POD). Next all patients operated with TaTME technique and matched control TME group were analyzed. Matching was performed in terms of no differences in tumor staging, distance from the sphincter, presence of neoadjuvant radiochemotherapy, age, BMI and ASA scale. The difference in postoperative complications between patients operated for TaTME and TME group were assessed. Only patients who didn’t develop an infectious complication were included for further analysis. Blood samples were analyzed for the concentration of C-Reactive Protein (CRP), Procalcytonin (PCT), Interleukin 6 (Il-6), White blood count (WBC), and Albumin in 1,2 and 3 POD.
Results: A total of 223 patients (75 TaTME and 147 in TME group) were recruited. Next 75 patients from control group were matched and included for further analysis. Postoperative morbidity occurs in 12 (16%) cases in TaTME group and in 17(22.7%) cases in control group (p = 0.30). In case of inflammatory markers statistically significant differences were observed between groups for CRP on 2 [ TaTME—93.67 ± 52.60; TME 123.02 ± 62.10; p = 0.04] and 3 POD [ TaTME—72.27 ± 55.10; TME 113.10 ± 62.10 p = 0.04]. In case of Il-6 those differences were observed on 2 POD [TaTME—17.99 ± 11.80; TME 44.34 ± 22.84; p < 0.01].
Conclusion: Compared to TME, TaTME is associated with lower production of inflammatory markers. That appears to be associated with less severe generalized inflammatory response and reduced perioperative trauma.
Colorectal—malignant
P095—Evaluation of short-term outcomes and sexual and urinary function after robotic surgery for rectal cancer: exploreing learning effects of experienced
Hiroshi Oshio1, Y.O. Oshima2, F.M. Fuyuhiko1
1Yamagata University Hospital, Department of First Surgery, 2Sendai Medical Center, Department of Surgery, Japan
Background and purpose: We have introduced robotic surgery for rectal cancer since October 2015. In the ROLLAR trial, it was shown that the more experience of robotic surgery, the less the transition to open abdomen, regardless of the experience of laparoscopic surgery. In this study, we compare rectal robotic surgery and laparoscopic surgery, and report the effect of the number of experienced cases of the surgeon on postoperative short-term results and sexual and urinary function.
Subjects: The subjects were 211 rectal cancer patients who underwent surgery from May 2015 to April 2020. We performed robotic surgery in 100 patients (RALS group) and laparoscopic surgery in 110patients (LS group). Post-short-term results, sexual and urinary dysfunction were examined for cases more than 1 year after surgery. The number of cases experienced by surgeons as robots was 4 stages (Q1: 1–25 cases, Q2: 26–50 cases, Q3: 51 cases-75 cases, Q4: 76–100 cases), and each was examined.
Results: Operative time Q1 (282.4 min in the RALS group, 251.9 min in the LS group, p = 0.27), Q2 (260.4 min in the RALS group, p = 0.71) Q3 (246.1 min in the RALS group, p = 0.78) Q4 ( RALS group 213.8 min, p = 0.041), and the operation time of the RALS group was shortened with a significant difference in Q4 stage (compared by anterior resection). There was no significant difference in bleeding volume, RM positive rate, and complication rate. The IPSS score (5.60 in the RALS group, 8.93 in the LS group,(p = 0.0019) at the 12th month afterwards was significantly different in the RALS group. This tendency has been observed since the Q1 stage, (P = 0.065) also has a similar tendency. There is no significant difference in IIEF score and Wexner score.
Discussion: In our study, it was found that the operation time of robotic surgery was shortened with a significant difference in the Q4 stage of the number of experienced cases exceeding 75 cases. Furthermore, improvement of IPSS and urination QOL score was observed from the initial case of Q1 stage, and the advantages of robotic surgery such as stable visual field and delicate operability around nerves were observed from the initial stage of introduction.
Conclusion: It is expected that a cost of robotic surgery will be improved by the principle of competition in the future, and it is suggested that robotic surgery may become one of the standard treatments for rectal cancer.
Colorectal—malignant
P096—ECOVID—Effect of Coronavirus On Visual Identification of Disease: The Effect of COVID-19 on Endoluminal Diagnosis
Tom Vincent McIntyre, W. Duggan, E. Burke, K. Schmidt
Wexford General Hospital, Department of Surgery, Ireland
Aims: The SARS-CoV-2 2019 (COVID-19) pandemic has had a dramatic effect on the ability to deliver acute in-hospital care due to restrictions on elective and emergency services. This has been compounded by patients’ reticence to attend their general practitioner or emergency department. We sought to identify if these service disruptions affected the endoluminal diagnosis of malignancies in our Irish level 3 hospital.
Methods: All patients who received a diagnosis of colorectal, gastric, or oesophageal carcinoma who underwent endoscopy in our centre from March 2020 to the end of July 2020 were identified. As a control we also assessed all patients with the same diagnosis who were diagnosed between March and July 2019. Averages expressed as mean ± standard error of the mean.
Results: There were 184 ± 79 endoscopies performed monthly during the affected period in 2020 compared to 341 ± 26 for 2019. There were 23 malignancies during the time period in 2020 compared to 31 in 2019. Only two colorectal cancers were identified on routine colonoscopies in 2020, all other malignancies were identified on urgent scopes in both years. The mean time from referral to scope was 25.5 ± 9.6 days compared to 22.3 ± 3.3 and mean number of diagnoses per month was 4.6 ± 0.9 compared to 6.2 ± 0.6 per month days with no significant difference observed noted (p = 0.758 and p = 0.171 respectively).
Conclusions: Despite unprecedented strains on the health service and a severe reduction in endoscopy activities, our institution preserved urgent endoscopy services with no significant impact on waiting time. Further follow up is underway to assess if patients presented with later stage disease.
Colorectal—malignant
P097—Apical node metastasis rate in colorectal cancer treated with minimally invasive radical resection with D3 lymphadenectomy: single center experience
Mustafa Yener Uzunoglu1, O. Yalkin2, F. Altintoprak3, B. Kamburoglu1, F. Celebi3, E. Akin1, M. Yigit1
1Sakarya University Research and Educational Hospital, Department of General Surgery, 2Sakarya University Research and Educational Hospital, Bursa City Hospital, Department of General Surgery, Department of Surgical Oncology, 3Sakarya University Faculty of Medicine, Department of General Surgery, Turkey
Aim: Lymph node metastasis is an important factor for predicting the prognosis of colorectal cancer patients. Skip metastases were common in colorectal surgery specimens, with an incidence of 3.7%–18.2%. We have evaluated the number of metastatic lymph nodes, total number of lymph nodes, lymph node ratio (LR), total number of apical lymph nodes, number of apical node metastasis in rectosigmoid cancer patients who underwent minimally invasive radical resection with D3 lymphadenectomy.
Methods: The subjects were 34 consecutive patients who underwent minimally invasive radical resection (robotic and laparoscopic) with D3 lymphadenectomy for rectosigmoid cancer between January, 2010 and December, 2020 at Sakarya University Research and Educational Hospital.
Results: The median age of the patients (34 males and 10 females) was 61,7 years (42–85 years). Ten patients had rectosigmoid cancer (29.5%), 24 patients had rectal cancer(70.5%). Twenty (58%) laparoscopic and fourteen (42%) robot-assisted colorectal surgeries were performed. The median number of harvested lymph nodes was 17,3 (12–35 lymph nodes) mean total number of harvested lymph nodes was 17.3, mean number of harvested metastatic lymph nodes was 3.4, median number of harvested apical lymph node was 1.97, lymph node ratio was 0.195. Higher LNR was significantly associated with shorter overall survival and disease free survival. One patient (3.4%) had apical node metastasis with T3 tumor, which was a skip metastasis, had lymphovascular and perineural invasion.
Conclusion: Complete resection of the primary tumor and regional lymph nodes has been accepted as the most important task in the treatment of colorectal cancer. Skip metastasis is an important concern that should be considered in lymph node evaluation. High-tie surgery and thorough extensive lymphadenectomy should be routinely performed in colorectal cancer surgeries to incorporate apical lymph node for accurate staging. Minimally invasive surgery may be safe and acceptable in the treatment of colorectal cancer patients.
Colorectal—malignant
P098—Application of TaTME to rectal high difficulty surgery in our hospital
Yukiko Oshima1, O.H Oshio2
1Sendai Medical Center, Surgery, 2Yamagata University Hospital, Department of First Surgery, Japan
Background and purpose: There is a report that the non-inferiority of laparoscopic surgery to open surgery has not been proven in the radical rectal cancer surgery. TaTME is expected to solve these problems in the future. We have introduced TaTME since March 2016. We will introduce about the attempt and standardization of TaTME in rectal cancer in our hospital.
Subjects: We performed 24 cases of TaTME since March 2016 to December 2020. The surgical indications were lower rectal tumors (cancer, GIST, etc.), male, narrow pelvis, giant tumor, and history of surgery. Confirmation of Endpelvic fascia on the tumor anal side and selection of the peel layer of below the fascia can be expected to ensure CRM. In addition, it is relatively easy to confirm the rectal urethral muscle in the front, and the separation line can be determined to secure CRM. In re-surgery cases, a transanal approach without surgical intervention can be a safe operation.
Conclusion: In difficult cases such as narrow pelvis, giant tumor etc., transperitoneal operation limits the operation of forceps on the anal side of the tumor and is often difficult to observe, and it is difficult to secure CRM. It was suggested that TaTME could improve them.
Colorectal—malignant
P099—Extracorporeal hand-sewn side-to-side isoperistaltic ileocolic anastomosis during laparoscopic right hemicolectomy: is the new always better?
Rosa Scaramuzzo, A. Balla, F. Saraceno, A. Guida, P. Lepiane
San Paolo Hospital, General Surgery Unit, Italy
Aims: In the last decade, a great effort has been dedicated about the investigation on the intracorporeal (ICA) versus extracorporeal anastomosis (ECA) during minimally invasive right hemicolectomy. The most employed surgical technique for the anastomosis creation, both in case of ICA and ECA, is the mechanical one with the hand-sewn closure of the enterotomy. In comparison to ECA, ICA seems to have some benefits regarding a quicker return to physiological bowel function. The aim of this study is to report our experience with extracorporeal hand-sewn side-to-side isoperistaltic ileocolic double layer anastomosis (EHSIA) during laparoscopic right hemicolectomy for adenocarcinoma.
Methods: This is a retrospective study of prospectively collected data. From October 2018 to November 2020, 49 patients underwent right hemicolectomy in our center. Of these, 41 patients (25 men, 16 women, median age 73 years (range 42–89 years), median body mass index 25 kg/m2 (range 17.52–36.4 kg/m2) underwent laparoscopic right hemicolectomy with EHSIA, and were included in the present study. Anastomosis was performed by two semi-continuous sutures in vicryl 2.0. A median abdominal wall incision was performed for the ileum and colon extraction. Both ileum and colon are divided with linear stapler. Before the anastomosis, ileal and colic stumps were reinforced by a non-absorbable hand-sewn suture.
Results: Six associated procedures were performed (three cholecystectomies and three umbilical hernia repairs) (14.6%). Three conversions were required (2 adhesions, 1 peritoneal carcinosis) (7.3%). Median operative time was 140 min (range 105–240 min). Five postoperative complications were observed: two anemia without rectorrhagia treated by transfusion (4.9%), one anastomotic leakage treated by radiological drainage (2.4%), one cholecystitis (2.4%) and one pneumonia (2.4%) both treated by antibiotics. Median number of lymph-nodes harvested was 17 (9–30). Median postoperative hospital stay was 7 days (5–15 days).
Conclusions: EHSIA showed intra and postoperative results similar to those reported in literature with ICA and ECA both mechanical and manual in terms of anastomotic leakage, bleeding and length of hospital stay. In our opinion, EHSIA with a double layer suture could have less clinical impact in case of leakage and it allows to achieve better hemostasis in comparison to one layer suture. Hand-sewn anastomosis should be part of surgeon’s experience.
Colorectal—malignant
P100—Use of laparoscopic equipment for colonoscopy intraoperatively in case of lack of colonoscope
Stefanos Stefanou1, Kostas Tepelenis1, C. Stefanou2, S. Koulas1
1University Hospital Of Ioannina, Surgical, 2General Hospital Of Filiates, Surgical, Greece
In the case where intraoperative endoscopy is necessary and there is no endoscope available in the hospital, there is a solution, the use of available laparoscopic equipment. The technique is simple and without being time consuming. All its needed is a laparoscopic video- camera, and laparoscopic ports. The whole procedure takes place in the surgical field and provides an immediate solution for the endoscopic inspection of stomach, small intestine and large intestine. We describe the first case where it takes place in an open right colectomy in a patient with colon cancer and a suspicious lesion at the left colon. Further studies are needed to evaluate the indications and the effectiveness of the method.

Colorectal—malignant
P101—ERAS implementation in emergency colorectal surgery: a lesson learned during COVID-19 experience
Diletta Cassini, Gabriele Epifani, C. Accardo, G Baldazzi
Sesto San Giovanni Hospital-ASST Nord Milano, General Surgery, Italy
Aim: Coronavirus disease 2019 (COVID-19) spreading has created challenges in Italian healthcare systems never seen before. In our center, elective procedures for benign and malignant disease have been cancelled and only emergency surgery was allow.In recent years enhanced recovery after surgery program (ERAS), has become the gold standard for elective colorectal surgery in terms of reduction post-operative medical complications but few data are available regarding emergency set. This study aimed to evaluate the results of a “tailored “ ERAS protocol application in emergency colorectal resection.
Methods: Data on postoperative medical records of all patients undergoing emergency colorectal resection from March 2020 to December 2020 were collected. A “tailored” ERAS programme is adopted and clinical outcomes were analyzed.
Results: This study included 55 patients underwent colorectal resection in emergency pathway in the COVID-19 period. Rates of overall complication and severe complication were 30% and 18%, respectively. The 60-day mortality was 1,8%. Median length of postoperative stay was 6 days. Adherence to more than 16 ERAS items was associated with lower morbidity and shorter hospitalization.
Conclusions: The tailored ERAS programme was feasible and safe for patients with a emergency colorectal resection and was associated with reduced postoperative complications and shorter hospital stay.
Colorectal—malignant
P102—Our laparoscopic operations for locally advanced lower rectal cancer following short-course chemoradiotherapy
Yoshihiko Nakamoto, R. Okamoto, K. Nagano, G. Matsuki, N. Ichise, M. Kasai, I. Hamano, T. Nakajima, S. Ikuta, T. Aihara, H. Yanagi, N. Yamanaka
Meiwa Hospital, Surgery, Japan
Background: In order to improve the outcome of treatment for locally advanced lower rectal cancer (LALRC), a comprehensive treatment including preoperative chemoradiotherapy is required. We present individualized treatment strategies based on our preoperative short-course chemoradiotherapy (SCRT) and surgical technique.
Methods: ①SCRT using hyper-fractionation method is performed to secure CRM due to tumor shrinkage, reduction of cancer cells with viability, and reduction of radiation hazard for 173 resectable LALRC (more T3 or N1). ②The patient underwent radical surgery after one month of SCRT. For 69 more LALRC (T4 or N2), induction chemotherapy is performed before SCRT. The surgical procedure is performed according to usual lap TME. Anal canal dissection is completed, DST anastomosis can be often done for female cases. Because of the leaching solution and smoke during dissection under the influence of SCRT, appropriate suction is necessary. ISR is based on partial ISR. If possible, a colonic J-pouch can be added, and a pelvic floor repair may be added for ESR cases and older people. TaTME is useful for difficult cases when approaching from abdominal side and for shortening the operation time, but in cases with strong anorectal angle, attention should be paid to visual field development on the scarred dorsal side. For cases when it is necessary to have images before SCRT, LLND is performed, as the depth feeling in a narrow space gained by 3D image is considered to be more advantageous in 2D.
Results: ①T down-staging: 45%, ypN0: 75%, pCRrate: 6.5%, anal sparing ratio: 96%, 5-yr LFS: 94%, RFS: 79%, OS: 90%, Leakage rate 7% ②T down-staging: 70%, ypN0: 61%, pCRrate: 10%, anal sparing ratio 90%. 3-yr LFS: 87%, RFS: 64%, OS: 88.6%, Leakage rate 8.3%
Conclusions: Radical surgery for LALRC after SCRT and ICT make it possible to secure CRM by tumor shrinkage and anus preservation by various operative contrivances, and is a promising treatment in local and remote control.
Colorectal—malignant
P268—A propensity score-matched analysis of advanced energy devices and conventional monopolar device for colorectal cancer surgery: comparison of clinical and oncologic outcomes
Sung Uk Bae, Woo Jin Song, W.K. Jeong, S.K. Seong Kyu
Keimyung University Dongsan Hospital, Surgery, Korea
Background: The safety, efficiency and versatility of novel surgical energy devices have been proved by recent studies. The aim of this study is to investigate the impact of surgical energy device on operative and oncologic outcomes of minimally invasive colorectal cancer surgery.
Materials and methods: The study group included 80 patients who underwent a minimally invasive colorectal cancer surgery with conventional monopolar device and 217 patients with surgical energy devices including ultrasonic shear or integrated bipolar and ultrasonic device between August 2015 and December 2017. The propensity scoring matching with Hosmer–Lemeshow test (p = 0.382) for tumor’s lesion, pre-operative CEA, operation technique, pathologic T stage and lymphovascular invasion produced 63 matched pairs.
Results: In patient characteristics, there was no significant difference between two groups after the propensity scoring matching. The amount of blood loss (72 vs. 54, p = 0.123) and conversion cases to another surgery (11.1% vs. 4.8%, p = 0.187) tended to be higher in monopolar group, while operation time and intraoperative complications were not significantly different. The short-term clinical outcomes including time to soft diet, the length of hospital stays and the morbidity within 30 days after surgery and pathologic outcomes were comparable between two groups. During the median follow-up periods of 29.0 months and 23.7 months in the monopolar and energy device groups, the 3-year overall survival rates of the monopolar and energy device groups were 88.2% and 93.7% (p = 0.438), and the 3-year disease-free survival rates were 83.3% and 88.7% (p = 0.619), respectively. Multivariate analysis showed that differentiation (p < 0.001), tumor budding (p = 0.010), and the sideness of tumor (p = 0.013) were independent prognostic factors for overall survival, and age (p = 0.016), differentiation (p = 0.002), and perineural invasion (p = 0.003) were independent prognostic factors for disease free survival.
Conclusion: The use of surgical energy device based on surgeons' preference did not show the significant impact on operative and mid-term outcomes compared with conventional monopolar device in minimally invasive colorectal cancer surgery.
Colorectal—malignant
P325—Initial experience in laparoscopic peritonectomy and Hipec for the treatment of peritoneal metastasis in a newly establish center
Abdullah Alqattan, A. Alammary, A. Alewadhi, H. Alwadae, M. Alzemanan, A. Alromaih, S. Mowallad, H. Alhabes, A. Abdulrahim, Q. AlQurashi, Y. Alsagoor, T. Mahnashi, M. Alhajlan, M. AlQannas, M. ALYami, D. Cortes Guiral
King khalid hospital, General surgery, Saudi Arabia
Background: Laparoscopic peritonectomy has been described as a feasible and reproducible technique, however it is technically challenging and requires specific training.
Objective: Our aim is to present our experience on laparoscopic peritonectomy and laparoscopic HIPEC in a newly stablish center.
Methods: A retrospective analysis from march 2019 to June 2021 from the King Khaled Hospital (Najran, Saudi Arabia) HIPEC data base has been conducted for every patient who underwent complete laparoscopic cytoreductive surgery with HIPEC. An exhaustive registry was made of all clinical relevant data, surgical procedure, outcome criteria as overall survival and adverse events according to (CTCAE) version4.0. All procedures were done by well-trained surgeon.
Results: Excluding cases converted to open due to adhesions, 5 patients were analyzed, 3 of them were female. Median age was 43 years. PM were from appendix, colorectal and ovarian cancer for 3, 1, and 1 patient respectively. Median PCI was 8 (3–18) and median time of surgery (excluding HIPEC time) was 8 h (4.5–10.5). Hospital median length of stay was 8 days (only one patient was admitted for 2 days in ICU).
All patients underwent resection of the primary tumor, parietal peritonectomy and one of them total pelvic peritonectomy plus salpingo-oophorectomy with histerectomy and extraction of the specimen through the vagina, 2 patient underwent bowel resection with anastomosis.
Three patients had complications, grade IV (hemoperitoneum), grade III (intestinal obstruction), grade II (port side hernia).
One patient died from covid-19 disease with severe pneumonia two month after surgery. The other 4 patients are alive without recurrence after a median follow-up of 8 months.
Conclusion: Total laparoscopic peritonectomy and laparoscopic HIPEC is feasible and safe, with shorter LOHS and the same or lower rate of complications compared to open CRS and the same oncologic results. In experienced centers it seems reasonable to offer our patients all the benefits of minimally invasive surgery.
Colorectal—malignant
P329—Fluorescence angiography protects against anastomotic leak in colorectal surgery: a systematic review and meta-analysis of randomized controlled trials
Jeremy Meyer1, H. Joshi2, N. Buchs1, F. Ris1, J. Davies2
1University Hospitals of Geneva, Digestive Surgery, Switzerland. 2Cambridge NHS Foundation Trust, United Kingdom
Background: Observational studies have shown that fluorescence angiography (FA) was protective against anastomotic leak (AL) in colorectal surgery, but high-quality pooled evidence is lacking.
Methods: MEDLINE, Embase and CENTRAL were searched for RCTs assessing the effect of intra-operative FA versus standard assessment of bowel perfusion on the incidence of AL of colorectal anastomosis. Pooled relative risk (RR) and pooled risk difference (RD) were obtained using models with random effects.
Results: One hundred eleven articles were screened, 108 were excluded and 3 were kept for inclusion. The three included RCTs compared assessment of the perfusion of the bowel during creation of a colorectal anastomosis using FA versus standard practice. In meta-analysis, FA was significantly protective against anastomotic leak (3 RCTs, 964 patients, relative risk: 0.67, 95%CI: 0.46 to 0.99, I2: 0%, p = 0.04). The risk difference between FA and controls was estimated to be of 4 percentage units (95%CI: -0.08 to 0, I2: 8%, p = 0.06).
Conclusion: The effect of FA on prevention of AL in colorectal surgery exists but is of small magnitude.
Colorectal—malignant
P340—High Ligation Of Inferior Mesenteric Artery Versus Low Ligation With Lymph Node Dissection Around Artery Root In Sigmoid Colon and Rectal Cancer Surgery
Yegor Tryliskyy1, C.S. Wong2, I. Demykhova3, A. Kebkalo4, V Poylin5
1North Bristol Trust, NHS, Division of Gastrointestinal Surgery, United Kingdom. 2University of Edinburgh, Surgery, United Kingdom. 3University of South Wales, Health Sciences, United Kingdom. 4Shupyk National Medical Academy of Postgraduate Education, Surgery, Ukraine. 5Northwestern Medicine, Chicago, IL, Surgery, USA
Introduction: Low ligation of inferior mesenteric artery (IMA) with lymph node dissection (LND) around IMA root has been proposed by several studies as potential alternative to high ligation. This study was set up to compare early postoperative outcomes and lymph node yield between both techniques in sigmoid and rectal surgery for cancer.
Methods: The study was registered with PROSPERO (CRD42021245160). A systematic literature searches of databases (EMBASE, MEDLINE, PubMed, CINAHL) were conducted according to the Preferred Reporting Items for Systematic Reviews and Meta-Analysis (PRISMA) guidelines through February, 2021 using predefined terms. Studies comparing LL (defined as ligation with left colic artery preservation) with LND and HL (defined as ligation of IMA at its root) of IMA in oncological surgery of the sigmoid colon or rectum were identified and retrieved. Random effects modelling to summarize statistics was performed using Review Manager 5.3 software. Mean differences (MD), standardized mean differences (SMD) and odds ratios (OR) were estimated for continuous and dichotomous outcomes respectively. The risk of bias was assessed using Newcastle–Ottawa score.
Results: Four retrospective observational studies with 1168 patients were included in the analysis. No difference was found in the operative time, intraoperative blood loose, the incidence of anastomotic leakage, postoperative ileus, postoperative urinary dysfunction. The length of stay was shorter in LL LND group. There was no difference in lymph node yield between two techniques.
Conclusion: There is no difference between LL with LND and HL in early postoperative outcomes or lymph node yield. Appropriately designed randomized controlled studies comparing long term survival and functional outcomes are required.
Colorectal—malignant
P341—D3 lymphadenectomy in tertiary hospital preliminary experience
Eduardo Rubio, A. Vivas López, O. García Villar, S .Garcia Caspueñas, L .Gonzalez González, A. Suárez Ramos, M. Labalde Martínez, J. Garcia Borda, E. Ferrero Herrero
Universitary "Hospital 12 de Octubre", Surgery, Spain
Background: Laparoscopic extended right hemicolectomy with D3 lymphadenectomy has been recognized as the most challenging surgery among all colon procedures. This surgery involves an extensive scope and a number of important organs, where a clear understanding of the superior mesenteric vein (SMV) anatomy is needed to complete the thorough dissection. To analyze our experience with laparoscopic right Mesocolectomy in right colonic cancers.
Methods: 14 consecutive patients were studied.
Results: Male:70%, mean Age: 72 yo Mortality was 0%; morbidity was 17%. Mean tumor size area was 33 ± 16 mm3, specimen length 24.3 ± 3.3 cm, distance from the tumor to proximal border was 103 ± 6 mm, distance from the tumor to proximal border was 80 ± 23 mm and mean lymph nodesharvested was 25 ± 3; mesocolic plane was achieved in 81% of cases. Survival was 83%; mean days hospitalizad was 6 days, with negative nodes was 88.7%. Recurrence occurred in 0 patients and received chemotherapy was mainly systemic (13.7%). Complications (Clavien-Dindo): I = 2 II = 1 II = 1 IV = 0
Conlusions: Laparoscopic right colectomy with lymphadenectomy and omentectomy showed to be safe and yielded surgical specimens of high quality, with probably impact on survival.
Colorectal—malignant
P342—Rescue hybrid approach using laparoscopy and transanal minimally invasive surgery to treat giant serrated polyp
Eduardo Rubio, A . Vivas López, O. García Villar, S. Garcia Caspueñas, A. Suárez Ramos, B. López de la Torre Molina, P. Peláez Torres, J. Garcia Borda, E. Ferrero Herrero
Universitary "Hospital 12 de Octubre", Surgery, Spain
We treated a 67-year-old man for high giant serrated polyp after incomplete endoscopic resection ans rescue by complete resection with laparoscopy and transanal minimally invasive surgery (TAMIS). We inserted the TAMIS device into the anal canal to above the anorectal ring and dissected to distal área. During resection left resection a perforation was identified. Abdominal laparoscopic approach was made. A management hybrid was performed to finalize the procedure. The rectal specimen was now fully mobilized. High rectal resection with combined laparoscopy and TAMIS provided a better surgical plane than standard laparoscopy or standard TAMIS for avoid total wall rectal resection.
Colorectal—malignant
P343—A rare case of anal melanoma: an entity to be aware of
Ahmed Dhaif, C. Boyle, K. Lowe, R. Paterson, A. Gumber
University Hospital Wishaw, Surgery, United Kingdom
Aim: Anal melanomas are a rare subset of malignancy and represent a small percentage of colorectal and anal cancers. Anorectal melanomas account for 0.4%—1.6% of all malignant melanomas. Their management represents a challenge due to lack of evidence, paucity in literature, aggressive biology and rarity of the condition. There is little consensus on management, but surgical resection offers the best chance of survival. Survival rates are generally poor at all stages, with a reported 5-year survival between 5 and 22%.
Methods: The is a case report of anal melanoma incidentally discovered in an elderly lady presenting to the bowel cancer screening unit.
Results: A 74-year-old female presented to the Endoscopy department after positive qFIT. Clinically, she was asymptomatic. During endoscopy, Perianal examination revealed a jet black naevus of approximately 3X3cm from 9 to 12’O clock position, overlying the perianal body, involving anal margin to the posterior vagina. General physical, abdominal and digital rectal examinations were unremarkable. Subsequently, she underwent an examination of rectum and vagina under general anaesthetics, and incisional biopsies obtained. Histopathology confirmed an invasive, superficial spreading malignant melanoma, with a Breslow thickness of 1.5 mm and Clark Level IV invasion. Staging CT scans did not reveal metastasis. Following local and regional MDT discussion, a combined colorectal and plastic surgery was offered. She underwent wide local excision of the melanoma from the posterior vaginal fourchette to the anal canal, bilateral perforator flap reconstruction, and defunctioning sigmoid loop colostomy. The patient did not have any intraoperative complications. She recovered well post-operatively. After the histopathology result, her tumour was staged as pT2b, N0, M0. She did not require any further treatment as per discussion in the MDT, post-operatively. No disease recurrence has been detected so far with a follow up of 35 months.
Conclusion: This case emphasizes the importance of early detection and treatment anal melanomas. Good oncological outcomes are feasible with wide local excision and radical surgery can be avoided in early stage disease.

Colorectal—stoma
P103—The possibility a laparoscopic approach through a single port
Ana Lozano Nájera1, Paula Martínez Pérez1, C. Cagigas Fernández2, L .Cristobal Poch2, P. Martínez Pérez1, E. Gonzalez Tolaretxipi2, M. Gómez Ruiz2
Hospital Universitario Marqués de Valdecilla, 1General Surgery, 2Colorectal Surgery, Spain
Aims: Rectal cancer is a common disease. Sometimes its diagnosis is late. This situation increases the possibility of presenting complications such as tumor perforation. Early diagnosis and effective treatment of this complication is important; as it can lead to a serious infection and compromise the patient’s life. The objective is to present the treatment of a patient with an abscessed rectal neoplasm.
Methods: The case of 69-year-old man is presented. He has a lower rectum adenocarcinoma and he is awaiting initiation of neoadjuvant treatment. He goes to the emergency room for intense anal pain and induration in the gluteal area. On examination, a tumor mass emerged through the anal canal. It also presents an erythematous and fluctuating region in the adjacent perianal area. In the analysis, the acute phase reactants are elevated. Therefore, it was decided to perform urgent surgery.
Results: Surgical intervention is performed using laparoscopic approach through a single port. An incision is made in the left iliac fossa and a single port is placed over the incision. A lateral approach is performed and the sigmoid colon is released. A loop colostomy is removed and it is fixed with loose stitches. The perianal abscess is drained and debrided, and a Penrose drain is placed inside. The postoperative period is satisfactory.
Conclusion: Performing a colostomy using a laparoscopic approach is very beneficial for the patient. And one option, it is performed through a single port. It allows a good assessment of the extent of the neoplasm. It also helps to appreciate the different possibilities of exteriorization of the intestinal loop. In addition, it avoids the performance of a wide and traumatic laparotomy with the psychological impact it implies for the patient.
Hepato-biliairy & pancreas—gallbladder
P104—Who should avoid single incision laparoscopic cholecystectomy for benign gallbladder disease: Lesson learned from 1405 consecutive patients in a single center
In Seok Choi, S.E. Lee, J.I. Moon
A Konyang University Hospital, General Surgery, Korea
Background: The purpose of this study is to recommend an optimal indication of single incision laparoscopic cholecystectomy (SILC).
Methods: We retrospectively reviewed the 1405 consecutive patients who underwent SILC at a single institution between April 2010 and June 2020. We defined difficult surgery (DS; conversion to multiport or open, adjacent organ injury, operation time ≥ 90 min, or estimated blood loss ≥ 100 ml) and poor postoperative outcomes (PPO; postoperative hospital stays ≥ 5 days, or postoperative complication ≥ grade II Clavien-Dindo classification). Subgroup analysis of acute cholecystitis (AC) was conducted according to the Tokyo guideline 18.
Results: Of the 1405 patients, 338 were for gallbladder (GB) stone, 121 were for GB polyp, 478 were for chronic cholecystitis, and 423 were for AC. The conversion and postoperative complication rate were 2.4% and 3.5%, the mean operation time and length of postoperative hospital stay were 51.8 min and 2.5 days. 89 and 94 patients were included in DS group and PPO group, respectively. In multivariable analysis, both grade I or grade II/III AC, and body mass index ≥ 30 kg/m2 were statistically significant predictors of DS. Grade II/III AC and age ≥ 70 years were statistically significant predictors of PPO. In subgroup analysis of AC, grade II/III AC group had longer operation time (57.2 vs 67.4 min, p < 0.001), postoperative hospital stays (2.7 vs 3.7 days, p = 0.001), higher complication rate (4.2 vs 15.8%, p < 0.001), and conversion rate (3.9 vs 15.8%, p < 0.001) than grade I AC group.
Conclusion: SILC should be avoided in patients with grade II/III AC for better surgical outcomes.
Hepato-biliairy & pancreas—gallbladder
P105—Index management of acute Cholelithiasis could be achieved in NHS with its positive impact on cost, patient social life and productivity disturbance
Noor Ul ain, R. Ganesh, A. Alijani, S. Zino, S. Bibi, N. Ikpete
Ninewells Hopsital, Upper GI and HPB surgery, United Kingdom
Background: Acute Gallstone diseases are common and constitute a substantive proportion of emergency admission. Index cholecystectomy is optimal strategy to prevent recurrent symptoms, readmissions, and morbidity. Limitation of resources is main hurdle in performing emergency cholecystectomy.
Aims: This study aimed to compare the outcomes of patients admitted with acute gallstone diseases between two period where index cholecystectomy was targeted in the second study period. We compared the number and proportion of patients with gallstone disease who had emergency cholecystectomy and its implications on bed occupancy.
Method: we compared the acute cholelithiasis admission and management between two oncall periods i.e. October 2019 and October 2020. In the second period, every index cholecystectomy was targeted and all patient were prioritized for surgery according to their clinical condition. Laparoscopic Cholecystectomy & intra-operative cholangiogram ± bile duct exploration was the standard procedure. Diagnosis, investigation and duration of stay, post-operative stay and complications were recorded.
Results: 11% (15 out of 134) of emergency admissions were due to gallstone disease during the second study period as compared to 42% (8 out of 18) in first study period.
46% patients had previous admission due to cholelithiasis in both study periods.In the second period 26% patient biliary cholic, 33% with acute cholecystitis, 26% ascending cholangitis and 7% acute pancreatitis. 46% patient underwent index cholecystectomy as compare to 25% in first period. All patient had LC and IOC and only 3 patients needed CBD exploration due to positive findings of IOC as compare to only LC in first period. Average duration of surgery was 2 h. Mean duration of post-operative stay was significantly shorter 3.5(Range 1–8) days compared to mean stay for patient who had conservative management 6 days (1–11 days). There was no intraoperative or post-operative complication, only one patient had readmission within 30 days and was managed conservatively.
Conclusion: Our findings suggested that it is possible with in the limitation of every service to improve the management of acute biliary admission according to guidelines. Index, and single session management of cholelithiasis disease can reduce hospital stay, potential recurrent admission and morbidity of cholestasis disease without significantly increasing morbidity. Dedicated list for acute biliary pathology one or twice weekly is needed. This is reflect by the fact that not all patient admitted with biliary pathology could be operated during the index admission due to emergency theatre availability. Index, and single session management of cholelithiasis disease will have a positive impact on the extra cost encountered during conservative management, recurrent admission and repeated investigation. This without considering the effects of recurrent admissions on patient social life and productivity.
Hepato-biliairy & pancreas—gallbladder
P106—"A Descriptive Analysis of Patients Who Underwent Laparoscopic Subtotal Cholecystectomy with the Amount of Blood Loss and Type"—a 6 year study
Lucas Riel Jr Bersamin, M. Mendoza, R. Cordero
Asian Hospital and Medical Center, Departemnt of Surgery/ Section of Minimally Invasive Surgery, Philippines
Introduction: There is a need to further understand the most basic bail-out procedure in laparoscopic subtotal cholecystectomy (LSC). Realizing the important outcomes in timing of surgery, equipment usage and amout of blood loss.
Objective: To determine if there is a significant difference in blood loss and total time of surgery while using conventional energy sources and advanced energy sources in laparoscopic subtotal cholecystectomy in Asian Hospital and Medical Center.
Methodology: All previous patients who underwent LSC will be analyzed and recorded for comparission of results, and analyzed for significance using the T-Test or Mann–Whitney Test.
Results: Patients in this study revealed a greater number of male patients (25) who were operated on with laparoscopic subtotal cholecystectomy compared to the female population (9). The average blood loss of the male population had a greater amount of blood loss at 101.04 ml compared to the female population at 64.44 ml, but it don’t give a significant statistical value. The intra-operative findings most commonly noted were (1) edematous/thickened gallbladder walls (33/34), followed by adhesions (omental) and gallbladder distention. Patients operated on with laparoscopic subtotal cholecystectomy were also compared between the use of conventional energy devices (electrocautery/Diathermy) and advanced energy sources (Harmonic scalpel/ Ligasure) with regards the amount of blood lost in surgery. A total of 18 out of 34 patients were operated on with conventional energy devices (electrocautery/Diathermy) giving an average blood loss of 115 ml compared to the population who were operated on with an advanced energy device (16 patients) having an average blood loss of 46 ml. This value showed significantly lower levels of blood loss compared to the group of patients who utilized conventional energy devices.
Patients operated on the period within 24 h from admission revealed a lesser amount of blood loss compared to the to those operated on in 24 or greater (31.73 ml vs 138. 95 ml.
Patients operated on within 24 h typically revealed edematous/ thickened walls at 93.33% for the 15 patients operated on with laparoscopic subtotal cholecystectomy, followed by adhesions and gallbladder distention. For patients operated on within and beyond 48 h, the most common intra-operative finding would still be an edematous and thickened gallbladder wall noted to be at 94.7% of the patients with 18/19. The other intraoperative findings (unidentifiable infundibulocystic junction, distended gallbladder, adhesions) where then noted to be 68.4%.
Gallbladder remnant where closed accordingly and grouped into two units; (1) Fenestrating type, (2) Reconstituting type. 11 patients were noted to have undergone the fenestration type of closure which revealed an average total procedure time of 214 min compared to the reconstituting type of remnant closure at 170.91 min (n = 23). The amount of blood loss for the fenestrating type of closure also revealed 58.18 ml compared to the reconstituting type of closure at 107.22 ml. CONCLUSION: Most common intra-operative findings noted would be edematous/ thickened walls, closely followed by adhesions and distention, in general and within 24 and 48 h of surgery. The amount of blood loss during the time period showed lesser blood loss if the patient was operated on within the 24 h period compared to the 48 h period. The use of advanced energy devices has demonstrated lesser amount of blood loss compared to the usage of conventional energy devices. fenestrating type of LSC showed a longer operative time compared to the reconstituting type of LSC.
Hepato-biliairy & pancreas—gallbladder
P107—An alternative operative approach to gallstone ileus – Extraction of gallstone through an incidental Meckel’s diverticulum
George Bisheet, A. Dorra, T. Elnakhal
Kettering General Hospital-NHS Trust, General surgery, United Kingdom
Introduction/Aim: Gallstone ileus represents 1% of the causes of small bowel obstruction in patients under the age of 70, albeit 5% of patients for those older. Conventional management includes a laparotomy and an enterotomy with stone extraction, however, there remains no consensus on management of choledochoduodenal fistula yet.
Meckel's diverticulum, a remnant of the omphalo-mesenteric duct, presents in 2% of the population with debatable management when found incidentally during a laparotomy, depending on age, sex, and features of the diverticulum.
We present a case of gallstone ileus causing small bowel obstruction necessitating laparotomy. However, where a large 5 cm incidental, uncomplicated Meckel's diverticulum was found, it was utilised as a pocket for gallstone extraction as a safe alternative to a separate enterotomy.
Presentation: An 85-year-old female attended the emergency department due to central abdominal pain. A contrast-enhanced CT scan of the abdomen and pelvis showed a fistulous tract between the duodenum and the gallbladder with a large intraluminal stone blocking the distal ileum(1). A plan was made for laparotomy and enterolithotomy. During the procedure, a large, uncomplicated Meckel's diverticulum was found 30 cm proximal to the point of obstruction. Milking of the stone up to the diverticular cavity was done, and a 75 mm linear stapler was used to resect the diverticulum vertically at the base together with the stone inside without the need to perform an enterotomy(2).
Results: Safe extraction of the gallstone that was milked up to the cavity of an incidentally found Meckel's diverticulum and extracted all together with excision of the diverticulum without the need for a separate enterotomy. The patient's recovery was uneventful and there were no postoperative complaints on follow-up after 4 weeks from discharge.
Conclusion: In conclusion, utilising an incidentally found Meckel’s diverticulum as a pocket for extraction of a small bowel obstructing gallstone could be considered as a safe alternative way, saving operative time and minimizing the number of enterotomies that might induce stenosis.

Hepato-biliairy & pancreas—gallbladder
P108—The role of MRCP in investigation of symptomatic gallstone disease
Christopher Leiberman, G. Kizis, K. Khatri
Queen Elizabeth University Hospital, General Surgery, Glasgow, United Kingdom
Aims: To audit the role of MRCP in investigation of symptomatic gallstone disease against Association of Upper Gastrointestinal Surgery of Great Britain and Ireland (AUGIS) guidelines.
Methods: We analysed consecutive MRCP requests for gallstone disease from 18/1/21 to 16/2/2. We excluded patients with previous cholecystectomy, no previous ultrasound scan and poor visualisation of CBD. Patients were categorised into “Minimal”, “Low”, and “High” risk depending on their LFTs and CBD dilatation, in accordance with AUGIS guidelines. MRCP results were analysed for choledocholithiasis.
The low risk category was further analyzed to see if there was any difference between patients with abnormal LFTs but normal bilirubin and those with elevated bilirubin but normal CBD diameter found on abdominal ultrasound.
Results: There were 118 patients who had MRCP during that time. We excluded 50 patients using above criteria. Out of remaining 68 patients, there were 4 patients (6%) in minimal risk, 45 patients (66%) in low risk and 13 patients (29%) in high-risk group. There were no CBD stones found in minimal risk group. In low-risk group 13 out of 45 (28%) and 10 out of 19 (53%) patients had CBD stones.
There were 45 patients in the low-risk category. Of these, 18 had normal bilirubin, of which 4 (22%) were found to have a CBD stone. Elevated bilirubin was found in 27 patients, 9 (33%) of whom were found to have CBD stones.
Conclusion: In our experience MRCP requests in minimal and high-risk groups is in accordance with AUGIS guidelines. In low-risk group 28% of our patients had CBD stones, much higher incidence as reported in AUGIS estimation (10%). Patient with an abnormal bilirubin but normal biliary tract appeared to have more CBD stones. We conclude that MRCP is a valid investigation in patients with abnormal LFTs but normal biliary tract.
Hepato-biliairy & pancreas—gallbladder
P109—An audit to review the use of percutaneous cholecystostomy to manage biliary disease
Monique Laudat, A. Khanna, B. Keeler, A. Qureshi
Milton Keynes University Hospital, General Suregry, United Kingdom
Percutaneous cholecystostomy tube drainage is often used to manage patients with acute cholecystitis, who are not suitable for surgery. It has been successfully used as both a definitive procedure and as a bridge to delayed laparoscopic cholecystectomy in the acutely unwell. There remains a variable consensus amongst clinicians regarding the indications and timing of tube placement. This audit aimed to determine if current patient selection met the criteria detailed in the National Institute of Clinical excellence (NICE) guidelines for biliary disease management.
A retrospective audit of adult patients who had a percutaneous cholecystostomy tube placed between January 2015 and December 2020. Data was collected from the case notes of 24 patients and analysed using Microsoft Excel. All patients were stratified according to demographic data, indication, Charlson Comorbidity Index, radiological approach, medication use, time interval from presentation to drain insertion, post-operative complications, mortality and whether they underwent subsequent cholecystectomy.
Results showed that only 4% of the patient cohort met the indications for cholecystostomy placement as defined by NICE. 42% of patients had a Charlson comorbidity index less than 4 and should have been deemed suitable candidates for primary cholecystectomy. There were no intraoperative complications, however the mortality rate was 17%. All patients were considered for interval cholecystectomy.
Clarity about which patient groups meet the criteria for cholecystostomy placement is needed to ensure patients receive the appropriate level of care.
Hepato-biliairy & pancreas—gallbladder
P110—Difficult laparoscopic cholecystectomy in acute cholecystitis
Iurii Mikheiev, O. Shpylenko, V. Yareshko
State Institution “Zaporizhia Medical Academy of Post-Graduate Education Ministry of Health of Ukraine”, Surgery and Minimally Invasive Technologies, Ukraine
Aims and preface: Tokyo Guidelines 2013 and 2018 (TG2013/2018) have recommended an aggressive surgical approach for acute cholecystitis (AC) when most of the patients should undergo surgery as soon as possible. Here is our experience of implementation of such an approach. We evaluated safety and feasibility of early laparoscopic cholecystectomy (LapC) in AC with TG2013/2018 severity grading.
Methods: We retrospectively reviewed institutional data from 2015 to 2020, 323 cases of AC were identified. After the admission every patient was evaluated with TG2013/2018 diagnostic and severity grading criteria. Based on the latter, patients with Grade 1 (197) and Grade 2 (113) AC underwent surgery in 24 h after admission. Grade 3 patients (13) received intensive care and underwent interventional cholecystostomy in 24 h after admission. We estimated mortality, morbidity, surgical complication rate, especially rate of bile duct injury (BDI), conversion rate, length of hospital stay and type of the surgical procedure performed.
Results: There were no deaths in Grade 1 and Grade 2 groups. 3 patients died in Grade 3 group due to multiple organ failure. Intraabdominal abscess formation postoperatively was observed in 14 patients (4.3%). Postoperative bile leakage was observed in 26 patients(8%) due to bile duct hypertension – successfully treated with ERCP. Bile duct injury in 2 patients, they were recognized intraoperatively and managed via Roux-en-Y hepaticojejunostomy. There were 9 conversions to open cholecystectomy, 2 of them due to adhesions after previous abdominal surgery. All conversions were in Grade 2 patients. In Grade 1 group average hospital stay were 2.3 days, in Grade 2 group—5.7 days, and in Grade 3—20.4 days. In most of the patients (292, 90.4%) successful LapC was performed, from these 292 in 16 cases subtotal cholecystectomy was performed due to high risk of the bile duct injury and inability to achieve critical view of safety. In 4 from these 16 patients bile leak was observed, which was managed with ERCP. None of the patients with subtotal cholecystectomy had recurrent symptoms.
Conclusions: Early LapC for AC is a safe and feasible procedure, which has prevalence in hospital stay, and bears low risk of bile duct injury. Subtotal cholecystectomy is a useful option for the cases when severe local inflammation makes classic LapC very risky.
Hepato-biliairy & pancreas—gallbladder
P111—Endobag extraction versus direct extraction of gall bladder during laparoscopic cholecystectomy, Is routine usage of Endobag mandatory? prospective cohort study
Sherif Albalkiny1, M.G. Qassem2
1Aneurin Bevan Health Board, General surgery, United Kingdom. 2Ain Shams university Hospital, General surgery, Egypt
Background: During laparoscopic cholecystectomy (LC), the optimal method of retrieval of gall bladder (GB) specimen has not been agreed yet. This study aims to determine how mandatory it is to routinely use Endobag for GB extraction in comparison with direct extraction. Settings: General Surgery department at Ain Shams University Hospitals (ASUH).
Methods: This prospective cohort study recruited patients who underwent LC between March 2017 and March 2019. This cohort was divided into two groups; Group A had Endobag extraction (EE) and group B had direct extraction (DE). Both arms were compared regarding procedure-related and post-operative variants.
Findings: This study included 100 patients who presented to ASUH with different presentations of GB stones. Mean age of participants was 41.34 ± 11.73 in group A, and 42.96 ± 10.53 in group B. Spillage of bile and/or stones took place in the epigastric port-site in 8 individuals (16%) of group B, and only one patient (2%) in group A, P-value was 0.031. Cases who had EE stayed in the hospital for only a mean of 23.68 ± 6.26 h in comparison with 27.08 ± 3.23 h of DE cases, P-value was 0.001. Port-site infection was discovered in 12% (6 patients) of the DE arm and none of the opposing group, P-value was 0.027. At 24 h post-operatively, 8 cases (16%) of group A and 11 cases (22%) of group B experienced pain (P = 0.611), and mean VAS score was 1.84 ± 0.91 and 3.14 ± 0.61 in both groups respectively (P = 0.001).
Interpretation: The use of Endobag in LC is not routinely mandatory in uncomplicated GB stones. However, it is highly recommended in complicated GB stones like mucocele and empyema as it minimizes port-site spillage, port-site infection, VAS scores and hospital stay.
Keywords: laparoscopic cholecystectomy, gall bladder extraction, endobag.
Hepato-biliairy & pancreas—gallbladder
P112—Significant morbidity follows elective laparoscopic cholecystectomy: call to improve patient information and consent
James Lucocq, G. radhakishnan, J. Scollay, P. Patil
Ninewells Hospital Dundee, Department of upper GI and general surgery, United Kingdom
Introduction: The literature lacks a comprehensive and complete account of the post-operative course following elective laparoscopic cholecystectomy (LC). When quantifying risk preoperatively, surgeons may place considerable emphasis on bile duct injury, but overlook other outcome measures including rates of other significant complications, re-intervention, prolonged hospitalisation and readmission. This cohort study provides a detailed description of outcomes to inform the consent process.
Methods: All Patients who underwent elective LC between January 2015 and January 2020 were considered for inclusion in the study. Data were collected retrospectively from multiple regional databases using a deterministic records-linkage methodology. Patients were followed up for 100 days postoperatively for adverse outcomes.
Results: 2164 LC were performed (age[range], 52[13–92]; M:F,1:2.7). Significant intra- and post-operative complications were identified in 1.8% and 4.2%, respectively. 8.4% of patients required additional postoperative imaging, 2.6% required further intervention and 6.6% had a prolonged postoperative stay. Rates of conversion to open and bile duct injury were low (1.2% and 0.18%, respectively). 6.0% patients were readmitted, of which 67.7% required imaging and 26.2% required invasive intervention. Subtotal cholecystectomies were performed in 2.7% of cases, and associated with postoperative complication (42.4%), prolonged postoperative stay (81.4%) and readmission (23.7%). 0 bile duct injuries occurred in the subtotal cholecystectomy group.
Discussion: While BDI is a rare event, approximately 15% of patients experience some form of adverse event. The rate of subtotal cholecystectomy in the elective setting has never been described but a rate of 2.8% indicates a rising incidence with the goal of avoiding bile duct injury. Patients need to be made aware of this and a multitude of lesser, yet significant, complications that occur on a regular basis. Most complications do not require specialist HPB input and can be safely managed by an experienced team with rapid access to radiology and ERCP.
Hepato-biliairy & pancreas—gallbladder
P113—Laparoscopic surgery versus Endoscopy in the management Common Bile Duct Stones: systematic review and Meta-analysis
Hafs Elnagi Elhag1, O. Eltayeb2
1Peterborough City Hospital, Urology, 2Altanagalvin Hospital, General Surgery, United Kingdom
Aims: Failure of Gallstones in the Common Bile duct (CBD) to pass can lead to life-threatening complications such as acute cholangitis and acute pancreatitis. With the advancement in minimally invasive surgery, a 1 stage Laparoscopic Common Bile Duct Exploration (LCBDE) followed by Laparoscopic Cholecystectomy (LC) is a great alternative to removing the gallbladder and CBD stones provided the surgeon possesses the necessary skills. According to the current guidelines for managing CBD stones is the 2 stage approach, Endoscopic Retrograde Cholangiopancreatography (ERCP) followed by (LC). The objective of this study is to assess whether LCBDE + LC should be the gold standard in managing CBD stones by comparing the clearance rate of common bile duct stones, morbidity, mortality and the duration of hospital stay with ERCP + LC.
Methods: This is a systematic review with a meta-analysis which included RCTs of patients who were treated by the LCBDE/LC versus ERCP + LC. The PRISMA guidelines for reporting systemic reviews was followed. RCTs were collected by 2 authors Independently from Cochrane central register of controlled trials, Medline and Embase. Statistical analysis was carried out by a computer application called Review Manager using the Mantel–Haenszel method, the results were then plotted on a Forest Plot diagram and the 2 groups were then compared.
Results: 849 patients from 7 RCTs were included in the study, 426 patients in the ERCP + LC arm and 423 in the LCBDE/LC arm. According to the Meta-analysis, Laparoscopic Common Bile Duct Exploration with Cholecystectomy was significantly superior than ERCP + LC in terms of successful Clearance of CBD stone, mortality rate and Acute Pancreatitis. but had significantly higher rates in biliary leakages. There were no significant differences in Surgical Site Infections, Haemorrhages, Acute Cholangitis, Perforations, or duration of hospital stay between the two arms.
Conclusion: The current evidence suggests that LCBDE/LC is superior in successful CBD stone clearance, mortality and acute pancreatitis. However, further RCTs will be needed to assess overall Morbidity, surgical site infections, Haemorrhages, Acute Cholangitis, perforations, or duration of hospital stay. The current guidelines must be reviewed to consider LCBDE/LC as the gold standard in managing patients with CBD stones.
Hepato-biliairy & pancreas—gallbladder
P114—Technique of critical view of safety for acute cholecystitis cases during laparoscopic cholecystectomy
Ali Uzunköy
Harran University School of medicine, General Surgery, Turkey
Introduction: Edema and inflammation due to acute cholecystitis make it difficult to determine the biliary tract anatomy during laparoscopic cholecystectomy. Therefore, in these cases, surgery is delayed until the inflammation resolves. However, in cases such as biliary pancreatitis, early laparoscopic cholecystectomy may be required. Technique of critical view of safety technique applied in laparoscopic cholecystectomy in non-acute cases reduces bile duct injury. In this study, it was investigated whether Technique of critical view of safety technique can be applied safely in acute cholecystitis.
Matherial and methods: Laparoscopic cholecystectomy was applied to forty-two patients who applied for acute cholecystitis. Patients who applied for acute cholecystitis were divided into two groups: those who were operated in the first 72 h and those who were operated after 6 weeks. 26 cases of them were female and 16 of them were male. Fifteen cases were operated within the first 72 h. Twenty-seven cases were operated 6 weeks after medical treatment. The applicability of the critical view safety technique during the laparoscopic cholecystectomy, hospitalization times, the rate of complications, and the rate of conversion to open technique were compared between the groups.
Results: There was no statistical difference between the groups in terms of demographic data (p > 0.05). The operating times were slightly longer in patients who underwent surgery in the first 72 h (p < 0.05). In one case in those underwent surgery in the first 72 h group was not established critical vision safety and the first fundus technique was applied. In the first group, the structures within the hepatocystic triangles could not be revealed in one patient and the open procedure was converted. In the first group, hospitalization time were longer. There was no statistical difference between the groups in terms of postoperative complications except wound infection (p > 0.05). Wound infection was more observed in the first group (p < 0.05). laparoscopic cholecystectomy was performed without any problems in 2 cases of gallbladder empyema in the first group. Total hospital stay was significantly longer in the second group (p < 0.05).
Conclusion: In acute cholecystitis cases, critical viw of safety tecnique during laparoscopic cholecystectomy can be performed safely in the first 72 h. However, wound infection rates are increasing in this cases. Delayed laparoscopic cholecystectomy is more safe, but the total length of hospital stay is longer.
Hepato-biliairy & pancreas—gallbladder
P115—Prolonged post-operative stay following laparoscopic cholecystectomies and its contributing factors
James Lucocq, G. Radhakishnan, J. Scollay, P. Patil
Ninewells Hospital, Hepatopancreaticobiliary, United Kingdom
Introduction: Laparoscopic cholecystectomy (LC) is the treatment for symptomatic gallstone disease and LCs are commonly performed as a day case with low risk of complications. Patients who undergo LCs for gallstone disease are a heterogenous population with many variables involved in their management. Our aim was to identify the proportion of patients who stay 3 days or longer post-operatively and the variables that most contribute to prolonged patient stay following LC.
Method: We retrospectively collected data for all patients who underwent either an emergency or elective LC in a tertiary hospital from 2015 to 2020. Open cholecystectomies after conversion from laparoscopic cholecystectomy and unplanned bile duct explorations were included. Patients undergoing a planned open cholecystectomy, bile duct exploration or additional intervention during cholecystectomy (e.g. liver resection) were excluded. Variables associated with prolonged post-operative stay were identified using multivariate logistic regression models (variables included age, sex, emergency versus elective, complicated operative findings, intra-operative complications, post-operative complications requiring further imaging or intervention, subtotal cholecystectomy, drain insertion and significant post-operative pain).
Results: A total of 2775 patients were included between 2015 and 2020 (median age, 53 years (range 13–92); M:F, 1:2.7). Two-hundred and ninety-nine (10.8%) patients stayed at least 3 days following LC. The rate of prolonged post-operative stay (≥ 3 days) in emergency group was 25.8% versus 7.7% in the elective group (p < 0.0001). Of those with prolonged post-operative stay, 46.5% had an emergency LC (OR of prolonged stay 4.7, p < 0.0001); 58.9% had complicated operative findings (OR 10.02, p < 0.0001); 48.8% required intra-abdominal drains (OR 6.57, p < 0.0001); 21.4% had post-operative complications requiring further investigations or intervention during index admission (OR 4.24, p < 0.0001) and 41.8% had significant post-operative pain (OR 25.3, p < 0.0001). Age (years) was also associated with prolonged admission (OR 1.02, p < 0.0001).
Conclusion: The rate of prolonged post-operative stay following laparoscopic cholecystectomy is significant at 10.8%. Post-operative pain was an important contributing factor in more than 40% of these patients. Although some of the inherent risks of a complicated cholecystectomy including subtotal cholecystectomies, drain insertion and re-intervention cannot be eliminated, strategies should be implemented to minimise them. Most important is patient information regarding the possibility of prolonged postoperative stay and need for re-interventions. This should be followed by the clinical aim to optimise pain relief to reduce postoperative stay and make the stay tolerable for patients who have had complicated cholecystectomies.
Hepato-biliairy & pancreas—gallbladder
P116—Laparoscopic management of common hepatic duct leak after laparoscopic cholecystectomy due to Endoclip decubitus
Andrea Locatelli1, M.G. Confalonieri1, M. Arru2, M. Monteleone1, A. Costanzi1
1San Leopoldo Mandic, General Surgery, 2Treviglio ASST Bergamo Ovest, General Surgery, Italy
Bile duct injuries are the most common serious complications of Laparoscopic Cholecystectomy (LC). Biliary leakages (BL) have increased in the era of LC up to 3%. Our presentation, documented by videos, describes a case of BL 15 days after LC carried out in our institution on a 16 year old male for symptomatic chronic lithiasic cholecystitis. The BL was due to the twisting and decubitus of a 5 mm titanium single fire Double Shanked Clip placed on the Cystic Artery.
At relaparoscopy through the same ports of LC, after bile aspiration in a diffuse choleperitoneum, peritoneal lavage and adhesiolysis in the liver bed of the gallbladder, a biliary leak (Fig. 1) was found between the clips of the previous LC. After cystic duct (CD) and cystic artery (CA) stumps isolation (Fig. 2), a twisting of the CA stump was found, causing a decubitus of the clip closed edge on the right wall of the Common Hepatic Duct, just above the insertion of the CD in the Common Bile Duct. The lesion was 3–4 mm long and generated the leak. The clips on the CA were removed, the stump was closed with 5/0 monofilament non-reabsorbable stitches, and the lesion on the CHD was sutured as well with the same sutures. A drain was inserted in the abdominal cavity at the end of the procedure.
The post-operative course was uneventful, with the exception of a transitory elevation of liver function markers. A one year follow-up with 3 negative Magnetic Resonance CholangioPancreatography and negative liver function tests confirmed the absence of stenosis of the CHD.
The first case of surgical endoclip migration after LC was reported in 1992. The median time of clip migration is usually 2 years but varies from 11 days to 20 years. The clip we employed is shaped with parallel arranged bars with a gap in between which compresses the tissue. They stabilize the clip against axial dislodgement. A diamond-shaped inner clip profile leads to an enlarged contact surface on the tissue, thus preventing migration. The mechanism of clip twisting was never described before in literature, while the mechanism of clip migration is reported in few cases.
In our case, we tentatively attribute the twisting of the CA stump to the proximity of the clip placement to origin of the artery and to the weight of the clip.

Hepato-biliairy & pancreas—gallbladder
P117—Emphysematous cholecystitis as a complication of a colonoscopy: a case report
Francisco Marrana, R. Peixoto, C. Santos, C. Quintela, P. Valente, D. Melo Pinto, G. Faria
Unidade Local de Saúde de Matosinhos, General Surgery, Portugal
Colonoscopy is a safe and low-risk common routine procedure. In spite of that, complications such as hemorrhage, perforation occur as the most frequent ones, presenting more often in older patients with comorbidities. With less than 13 cases described until the present date, none of that being in Portugal, acute cholecystitis after colonoscopy remains a very rare event.
The theorized pathogenesis of post-colonoscopy cholecystitis combines dehydration and lithogenesis with traumatic bacterial translocation associated with colonoscopy. Nonetheless, no definitive physiopathology has been yet established.
This report aims to describe another of these cases, emphasizing the need to exclude acute cholecystitis as diagnosis of postcolonoscopy right upper quadrant abdominal pain.
A 78-year-old-man with rectal bleeding and radiation proctitis from treatment of prostate adenocarcinoma underwent a colonoscopy with standard bowel preparation. He presented to the emergency department with pain referred to the right hypochondrium and abdominal distension in the next day. Bleeding and perforation were excluded. Since the risk of infection presented high, as the patient was on regular immunosuppression from vasculitis, antibiotic prophylaxis was started and the patient was discharged. He returned 4 days after with clinical aggravation of previous symptoms. Physical examination unveiled focal tenderness with voluntary guarding in the right upper quadrant and blood analysis showed increased inflammatory parameters. An abdominal ultrasound was conducted revealing suspicion of emphysematous cholecystitis, which was confirmed by CT.
A laborious laparoscopic cholecystectomy with abdominal drainage was performed as the advanced stage of cholecystitis was in place. The post-operatory went uneventful and the patient was discharged after 3 days. Histopathology examination of the removed gallbladder confirmed acute emphysematous cholecystitis.
With this case report we intend to aware to this differential diagnosis. In spite of the absence of a physio pathological clear path, acute cholecystitis post-colonoscopy should be taken in consideration in patients after this exam presenting with right upper quadrant, particularly in elder patients with various comorbidities.

Hepato-biliairy & pancreas—gallbladder
P118—Learning by doing: an observational study of the learning curve for ultrasonic fundus-first dissection in elective cholecystectomy
My Blohm1,3, J Österberg1, G. Sandblom2, 3, L. Enochsson4, Y. Cengiz4, E. Austrums5, E. Abdon6, J. Hennings4, M. Hedberg1, U. Gustafsson7,3, A Diaz Pannes8
1Mora Hospital, Department of surgery, 2Södersjukhuset, 3Karolinska institutet, Department of Clinical Science, Intervention and Technology, Surgery, 4Umeå University, Department of Surgical and Perioperative Sciences, Surgery, 5Central hospital Kristianstad, Department of Surgery, 6Östersund hospital, Department of Surgery, 7Danderyd hospita, 8Södertälje hospital, Department of surgery, Sweden
Background: Surgical safety and patient-related outcomes are important considerations when introducing new surgical techniques. Studies about the learning curves for different surgical procedures are sparse. The aim of this observational study was to evaluate the learning curve for ultrasonic fundus-first (FF) dissection in elective laparoscopic cholecystectomy (LC).
Methods: The study was conducted at eight hospitals in Sweden between 2017 and 2019. The primary endpoint was dissection time, with secondary endpoints being intra- and postoperative complication rates and the surgeon’s self-assessed performance level. Participating surgeons (n = 16) were residents or specialists who performed LC individually but who had no previous experience in ultrasonic FF dissection. Each surgeon performed fifteen procedures. Video recordings from five of the procedures were analysed by two external surgeons. Patient characteristics and data on complications were retrieved from the Swedish Registry of Gallstone Surgery and Endoscopic Retrograde Cholangiopancreatography (GallRiks).
Results: Dissection time decreased as experience increased (p = 0.001). Surgeons with limited experience showed more rapid progress. The overall complication rate was 14 (5.8%), including 3 (1.3%) potentially technique-related complications. Video assessment scores showed no correlation with the number of procedures performed. The self-assessed performance level was rated lower when the operation was more complicated (p < 0.001).
Conclusions: Our results show that dissection time decreased with increasing experience. Most surgeons identified both favourable and unfavourable aspects of the ultrasonic FF technique. The ultrasonic device is considered well suited for gallbladder surgery, but most participating surgeons preferred to dissect the gallbladder the traditional way, beginning in the triangle of Calot. Nevertheless, LC with ultrasonic FF dissection can be considered easy to learn with a low complication rate during the initial learning curve, for both residents and specialists (Table 1).
Table 1.
Univariable and multivariable linear regression analysis with dissection time as outcome

Hepato-biliairy & pancreas—gallbladder
P119—Safety and feasibility of using the conventional laparoscopic instruments in trans umbilical cholecystectomy
Ahmed Elnabil-Mortada, H Elmaleh, A Iskandar, R Abdellatif
Ain Shams University Hospitals, General Surgery, Egypt
Background: Concept of scarless surgery (Fig. 1) for better cosmetic outcome has been described using different approaches like natural orifices access and single incision transumbilical laparoscopic surgery, but with challengeable ergonomic and economic difficulties due to the need for using special instruments, this has led to limit their widespread especially in low economic countries. We aimed here to study the feasibility, safety of using conventional instruments (Fig. 2) for transumbilical cholecystectomy (TUC) in one of the biggest university hospital in Egypt.
Methods: Prospective cohort study was conducted in Ain Shams University Hospitals, with total of 100 patients with symptomatic gall stones has been enrolled, between Jan 2016 and Jan 2018, comparing TUC using conventional versus special instruments, with 50 patients in each group (CI versus SI), respectively. Exclusion criteria were acute cholecystitis, acute biliary pancreatitis, choledocholithiasis, and higher BMI than 35, and ASA score higher than 2. Demographics, Operative, post-operative data and cost were collected and statistically analysed.
Results: There was sample homogeneity between both groups regarding age, sex, BMI. Over all mean operative time for the study was 45.75 ± 15.27 with median time 40.5 min. Operative time, conversion rate to conventional laparoscopy and post operative complications were higher in CI group, but without statistically significance. No CBD injuries or conversion to open surgery have been reported in both groups. Similar mean hospital stay and postoperative pain score in both groups, with highly significant reduction in the cost in favor CI group.
Conclusion: Using conventional instruments in transumbilical laparoscopic cholecystectomy is feasible & safe alternative approach by skilled patients in selected patients without any additional cost than conventional laparoscopic cholecystectomy.
Keywords SILS. Single Incision Laparoscopic Surgery. Transumbilical Cholecystectomy. Single Incision Laparoscopic Cholecystectomy. NOTES. Natural Orifice Transluminal Endoscopic Surgery.Conventional cholecystectomy.

Hepato-biliairy & pancreas—gallbladder
P120—Mini-laparoscopy with eras protocol for cholecystectomy and nissen fundoplication in covid-19 pandemic
Andrii Malynovskyi, M.M. Galimon, I.I. Horbachuk
Odessa national medical university, Robotic and endoscopic surgery, Ukraine
Aims: The need for fast recovery and expeditious discharge is current trend of laparoscopic surgery, especially in Covid-19 pandemic. The aim of study was to assess the results of mini-laparoscopic procedures with “day surgery” ERAS protocol.
Methods: From September till December 2020 we performed 14 mini-laparoscopic procedures: 6 cholecystectomies (MLC), 7 Nissen fundoplications (MNF) and 1 Heller myotomy with Dor fundoplication (MHM). Mini-laparoscopic Heller myotomy with Dor fundoplication was introduced at first. MLC was performed using 4 trocars: 10-mm umbilical, 5-mm subxiphoidal and two 3-mm for mini-graspers in right subcostal region. Inclusion criteria were: age under 60, BMI under 35 kg/m2, chronic cholecystitis and non-severe acute cholecystitis. MNF and MHM was performed using 4 trocars (two 5-mm trocars and two 3-mm trocars) and Nathanson retractor. All the trocars were inserved in left upper quadrant. Inclusion criteria were: age under 50, BMI under 30 kg/m2, small type 1 hiatal hernia (symptomatic, severe GERD), or early stage of achalasia. Initaially we included only women. From the beginning of pandemic male patients were also included.
Results: There were no conversions to standard procedures, no intra- and postoperative complications in all the patients. Postoperative stay was 1 day after MLC, 2 days after MNF, and 3 days after MHM, for all the patients respectively. Mean duration of surgery was 50 min (range, 40 – 70) for MLC, 140 min (range, 110 – 170) for MNF, and 210 min for MHM. Mean VAS score for intensity of pain on postop day 1 was 1.3 (range, 0–3) after MLC, and 2.2 (range, 0–3) after MNF and MHM. Half of patients had complete absence of pain on postop day 1. Mean VAS score of cosmetic result 2 weeks after surgery was 9,8 (range, 9–10) for MLC and 9,7 (range, 9–10) for NMF and MHM.
Conclusions: 1. Mini-laparoscopic cholecystectomy, Nissen fundoplication and Heller myotomy are good options for selected patients. 2. Mini-laparoscopic procedures minimize postoperative pain and allow to discharge patients on the next day after surgery, or on the second day. 3. More cases collection is needed to determine patient’s availability for mini-laparoscopic procedures, including their behavioral status.

Hepato-biliairy & pancreas—gallbladder
P121—Intraoperative cholangiography using indocyanine green dye (icg) during laparoscopic cholocystectomy: early experience
Maria Sotiropoulou, Stylianos Kapiris, A Kolinioti, N Ntargakis, M Psarologos, P Metaxas, H Kyzeridis, D Stergiou, E Kefalou, E Mavrodimitraki, K Paraskeva, M Kazantzi, P Alexakou, S Kapiris
"EVANGELISMOS" Hospital,Athens, 3rd Department of Surgery, Athens, Greece
Introduction: Injury of the common bile duct during laparoscopic cholecystectomy is a serious complication which is still reported in 0.4%. One of the uses of Indocyanine Green Fluorescence (ICG) in laparoscopic surgery is intraoperative recognition of the anatomy of the extrahepatic bile duct.
Aim: The aim of the present study is to document the applicability and clinical outcome of the intraoperative bile duct tree with indocyanine green (ICG).
Method: 61 patients with symptomatic cholelithiasis scheduled for laparoscopic cholecystectomy were included. Patients who had undergone preoperative ERCP, MRCP or had a previous episode of pancreatitis were identified as patients with complicated cholelithiasis (22.2%). All patients received 5 mg intravenously one to three hours preoperatively.
The somatometric data of the patients and their liver biochemistry were recorded before the surgery. Intraoperative events, surgical time and duration of hospitalization were checked.
Results: Imaging of the extrahepatic bile ducts and performing a critical view of safety was possible in all cases, Fig. 1. As for the time of display, this was possible at 66.7% before the exposure of cysic duct and artery and at 77.7% after Fig. 2.
In one case, the use of ICG led to a conversion avoidance, while in two other cases it led the surgeon to change the surgical preparation plan, Fig. 3. No bile duct injuries were reported. The average surgical time was 76 min, while the hospital stay was 1.8 days.
Conclusion: ICG cholangiography in laparoscopic cholecystectomy is feasible and could be used for intraoperative bile imaging and prevention of bile duct injuries.
Hepato-biliairy & pancreas—gallbladder
P122—Laparoscopic common bile duct exploration standardization. The advantages of minimally invasive surgery in choledocholithiasis removal
Juan Bellido Luque, Concepción Franco Peñuela, C. Franco Peñuela, M. Lopez Cantarero, I. Sanchez Matamoros, F. Oliva Mompeán, A. Nogales Muñoz
Virgen Macarena Hospital, Surgical Department, Spain
Introduction: In the early years after the advent of LC, the use of intraoperative laparoscopic common bile duct exploration (LCBDE) was limited. The use of ERCP for lithiasis removal significantly increased the cost of managing these patients. Several years later, the development of new laparoscopic techniques of CBD access and exploration, led to perfom minimally invasive approach. Both transcystic and transductal access methods were developed. We present our experience in the development of LCBDE and how this approach has changed the previous standard management compared to open CBDE.
Material and methods: All patients underwent routine preoperative preparation, including ultrasonography of the abdomen and the measurement of liver function tests, electrolytes, and amylase levels. RNM-cholangio was routinely performed in case of suspicious in US or jaundice.
After Choledocholithiasis is diagnosed, ERCP was performed. All patients with confirmed choledocholitiasis and non-effective or impossibility of preoperative ERCP, were included.
The aim of the study is to assess the postoperative complications and length of stay in two groups: Open and Laparoscopic CBDE. Continuous variables were described as means with standard deviation (SD), and categorical variables were reported as absolute or relative frequencies. Continuous variables were compared using nonparametric tests (Mann–Whitney U and Wilcoxon). Chi-square test was used to evaluate categorical data. Reported p values of < 0.05 were considered statistically significant.
Patients were placed in the supine position on the operating table with both lower extremities apposed. Monitor was located at the head of the table. Laparoscopic ports were placed: 10 mm umbilical and left midclavicular line, 5 mm epigastric, right midclavicular and right anterior axillary line. When possible, transcystic ductal exploration was preferred over choledochotomy for LCBDE. In some cases, choledochotomy was necessary or even the preferred route for LCBDE. If the transcystic route was initially chosen and if adequate progress in clearing the CBD of stones was not made within a reasonable amount of time, then a conversion to a choledochotomy approach was made.
In the transcystic approach, the gallbladder was retracted toward the right hemidiaphragm with forceps inserted through the most lateral port. The choledochoscope was inserted through the midclavicular port into the cystic duct and guided into the CBD with atraumatic forceps inserted through the medial epigastric port. Glucagon (1–2 mg) was administered intravenously by the anesthetist to relieve sphincter pressure. This procedure was combined with transcystic flushing of the duct with saline or contrast material in an attempt to force the debris into the duodenum.
When a choledochotomy was deemed appropriate, it was made longitudinally with a scalpel. The choledochoscope was inserted through the midclavicular port and guided into the CBD through the choledochotomy. Saline instillation through was employed at this time to expand the CBD and Stone removal. The primary indication for intraoperative transcistyc lithotripsy was > 2 mm stones that defied less aggressive removal techniques. Intraoperative laser lithotripsy was needed only rarely in this series.If complete stone clearance couldn´t be secure, choledochotomy was usually closed over a T-tube after the ductal exploration was complete. If multiple Stone were removed in > 80 years old patients, a choledocoduodenostomy was performed laparoscopically. Primary closure of the choledochotomy without T-tube placement was performed in cases where there was no evidence of residual distal ductal edema, or concern for retained stones or debris., 4–0 barbed suture was used to close the choledochotomy. A drain was placed adjacent to the closure in all of these cases.
Results: From 2012 to 2020 patients, 120 patients presented with symptomatic biliary tract disease. 70 men (58%) and 50 women (42%). 101 patients (84%) underwent preoperative without success ERCP. 19 patients (16%) had previous surgical gastric resection with impossible ERCP. LCBPD was started in our hospital in 2017.
90 patients (75%)underwent open CBPE y 30 (25%) LCBDE.
Laparoscopic group: Laparoscopic transcystic approach was attempted in 8 patients and completed successfully in 3 patients (10%). 2 patients were solved pushing the stones through the papilla and 1 patient using the Laser lithotripsy to achieve fragmentation. 27 patients were finally performed to choledochotomy and stone removal using choledocoscopy 3, 5 mm size. No t-Tube was used and choledochotomy were primary closed in 25 patients (93%) and choledochoduodenostomy was performed in 3 patients (7%).
Open group: No open transcystic access was performed. 90 patients underwent to open CBDE. Stone removal was successfully in all patients and in 75 patients (83%) the choledochotomy was closed through t-tube,3 patients (3%) the choledochotomy was primary closed and 12 patients (14%) underwent to choledochoduodenostomy or hepaticoyeyunostomy.
The primary choledochotomy closure rate was more often performed in laparoscopic CBDE than open CBDE with significant differences with significant differences In terms of complications 25% patients in open group showed postoperative complications. 18% of them presented surgical site infections and 17% intraabdominal abscess or pulmonary complications (Clavien-Dindo I)0.1 patients (3%) in laparoscopic group developed 4 × 3 cm biloma that was managed with intravenous antibiotics. No others complications were seen in this group. Significant differences in favour of laparoscopic group (p < 0,01).
The mean length of stay was 3 days in laparoscopic group and 14 days in open group with significant differences.
Conclusions: Laparoscopic CBDE reduces the length of stay, postoperative complications with significant differences than open procedure. Choledochoscopy with stones removal confirmation,primary choledochotomy closure and minimally invasive access, could be reasons these results in favour of laparoscopic CBDE.
Hepato-biliairy & pancreas—gallbladder
P123—Coledocoplasty in a patient with Mirizzi syndrome type IV plus choledocolithiasis of large elements
Arcenio Luis Vargas Avila, Ana Laura Sanchez Baltazar, J. Vargas Flores, J.F. Nagore Ancona, C.A. Cortazar Sanchez, J.M. Hernandez Garrido, J.A. Martin Perez, N.N. Espinosa Queb, L.A. Guerrero Galindo, A. Jimenez Leyva, J.A. Dominguez Rodriguez, J.A. Gonzalez Luna, I. De Alba Cruz, J. Sanchez Lora, L.A. Cab Cesar, A.J. Lara Valdes, S.J. Salgado Arzate, A.l. Sanchez Baltazar, L. Perna Lozada, H.F. Narvaez Gonzalez, J.A. Morales Hernandez, E. Bravo Roman
ISSSTE Mexico, Surgery, Mexico
Aims: Demonstrate the laparoscopic resolution of a complex case of large elements choledocolithiasis associated with Mirizzi syndrome type IV.
Methods: A 79 year old female patient with no significant medical history. She begins her current condition a month before her admission with abdominal pain in the right hypochondrium associated with jaundice. She meets Tokyo 2018 criteria for severe cholangitis, so ERCP was performed and choledocolithiasis of large elements was determined and only 10Fr stent was placed for bile duct decompression. She was scheduled for cholecystectomy and laparoscopic bile duct exploration 7 days after ERCP.
Results: During laparoscopy is found cirrhotic liver, scleroatrophic gallbladder with severe inflammatory process, firm adhesions of gallbladder to omentum, bile duct and duodenum, as well as dilated bile duct with cholecystocolecian fistula. Coledocotomy is executed, choledocholithiasis is demonstrated and Fogarty 3Fr balloon scanning was performed until clearance of the bile duct. Choledocoscopy is performed and intrahepatic lithiasis is seen, again scanning the right and left hepatic duct until they are empty and corroborated under direct vision with a choledochoscope. Choledocoplasty is performed with vicryl 000 and fibrin sealant is applied at the end. Adequate post-surgical evolution, without evidence of biliary leakage, tolerating diet and discharge on the eighth day.
Conclusions: It has been shown that with the performance of adequate dissection it is possible to make a satisfactory resolution to a case of lithiasis of large elements of the laparoscopic bile duct. The main objective is to maintain a safety culture and stay alert to identify risk situations.
Hepato-biliairy & pancreas—gallbladder
P125—Abberant right hepatic artery directly deriving from cystic artery. An extremely rare anatomical variation
Evangelia M. Stefou, S.G. Koulas, E. Doumkou, G. Papingioti, S. Stefanou, F. Siakas
"G. HATZIKOSTA" General Hospital of Ioannina, General Surgery, Greece
A 71-year-old man was admitted to our department in order to undergo an elective laparoscopic cholecystectomy. During the dissection of Callot’s triangle we recognize the cystic duct and cystic artery relatively with ease. Immediately after the right hepatic artery we observed a bifurcation of another artery, originated directly from the cystic trunk. The suvramentioned artery was preserved for 7–8 cm length approximately, until its entrance to the hepatic parenchyma. No other vascular or biliary abnormalities were occurred. Then, cystic duct and cystic artery clipped and divided. The patient recovered without any complications. To our knowledge, this is the first case where an aberrant right hepatic artery originates directly after the bifurcation of right hepatic artery and cystic artery.
Conclusions: Given the large number of laparoscopic cholecystectomies performed annually, better knowledge of anatomic variation of cystic artery may prevent arterial and potentially bile duct injury, particularly for those patients with unusual anatomy of the Callot’s triangle.
KEYWORDS: aberrant hepatic artery, cystic artery, laparoscopic cholecystectomy.
Li Li, Qiang Li, Mingguo Xie et al. Anatomic variation of the cystic artery: New findings and potential implications. Journal of Investig. Surg. Published online: 26 Jun 2019
Matthew J. Blecha, MD, Angela R. Frank, MD et al. Abberant Right Hepatic Artery in Laparoscopic Cholecystectomy. JSLS (2006)10:511–513
Narayanaperumal Mugunthan, Rajendran Kannan et al. Variations in the Origin and Course of Right Hepatic Artery and its Surgical Significance. Journal of Clinical and Diagnostic Research. 2016 Sep, Vol-10(9): AC01-AC04
Hepato-biliairy & pancreas—gallbladder
P126—The effectiveness of one-stage endovideosurgical interventions in the treatment of combination of gallbladder and bile duct stones
Aleksandr Ukhanov, D. Zakharov, S. Zhilin, S. Bolshakov, A. Leonov, V. Ambartzumjan, K. Muminov, E. Tiunova, J. Aselderov
Central Municipal Clinical Hospital, Surgical department, Russia
Background: According to World Health Organisation 10–15% of the world's population suffers from cholelithiasis. A combination of gallbladder and common bile duct stones is observed in 10–35% of cases, obstructive jaundice as a complication of cholelithiasis develops in 5–10%. The “gold standard” for treating cholecystolithiasis is laparoscopic cholecystectomy, but currently there are no specific recommendations for treating patients with a combination of gallbladder and common bile duct stones. Nowadays two methods of treating cholecystocholedocholithiasis are generally performed: two-stage in the form of a combination of endoscopic retrograde cholangiopancreatography and endoscopic papillosphincterotomy (ERCPG and EPST) with subsequent laparoscopic cholecystectomy and one-stage—simultaneous removal of the gallbladder and calculi from the bile duct.
Material and methods: Between 2015 and 2020 1,580 patients with cholelithiasis underwent surgical treatment. A combination of gallbladder stones with calculi of the common bile duct was identified in 186 (11.8%) patients. Indications for single-stage intervention included: the presence of large (5 mm or more) calculi in the common bile duct, the predicted impossibility of performing EPST due to the history of previous resection of the stomach by Billroth—2, the presence of parapapillary diverticulum, and the absence of general contraindications for laparoscopy. Initially by laparosoccopic access the common bile duct was isolated and supraduodenal choledochotomy was performed, stone extraction was performed using a Dormia basket under direct visual control using a choledochoscope. The exploration of common bile duct was completed by external T-drainage of the common bile duct according to Kehr. After this stage laparoscopic cholecystectomy was carried out.
Results: One-stage interventions were performed in 111 (59.7%) patients. Completely laparoscopic interventions in the volume of cholecystectomy, choledocholithectomy with external drainage of the common bile duct were successfully performed in 98 patients (88.3%). The conversion was performed in 13 (11.7%) patients, the cause of which was technical difficulties due to the insertion of the calculus into the large duodenal papilla, the presence of difficult infiltrative tissue changes in the hepatoduodenal ligament, Mirizi syndrome. In the early postoperative period, complications occurred in 10 patients (10.2%). In 8 cases (8.1%), there was bile leakage, which in 4 patients stopped spontaneously after 5–6 days, in the remaining 4 patients relaparoscopy was performed, and additional suturing on the choledochotomy defect. In 1 patient (1.0%) in the postoperative period, acute pancreatitis was diagnosed, which was treated by conservative measures. In 1 case (1.0%) during surgery for Mirizi syndrome, perforation of the colon developed with a picture of profuse intestinal bleeding, which required a right-sided hemicolectomy to be performed using traditional access. Late complications occurred in 5 patients (5.1%) after removal of the choledochostomy drainage 1 month after the initial intervention. Bile leakage developed to the abdominal cavity and all of the patients were treated by laparoscopic suturing of the bile fistula. Incomplete lithoextraction was diagnosed in 5 patients (5.1%), all of them subsequently underwent EPST. Postoperative mortality was 4.1% (4 patients). The cause of death was the combination of severe purulent cholangitis with the presence of a severe comorbidities.
Conclusions: Thus, our experience of laparoendoscopic interventions on the common bile duct shows their good feasibility and high efficiency in patients with cholecystocholedocholithiasis, purulent cholangitis and obstructive jaundice.
Hepato-biliairy & pancreas—gallbladder
P127—Gallbladder agenesis: case report and literature review
Mohamed Salama1, Mahmoud Salama2, Ahmed Salama3, Ibrahim Ahmed1, Sherif El Masry1
1Our Lady of Lourdes Hospital, General Surgery, Drogheda, 2Trinity College Dublin, 3NUI Galway, Ireland
Introduction: Gallbladder Agenesis (GBA) is a very rare congenital anomaly that represents a diagnostic challenge.
The clinical picture of biliary disease coupled with failure of standard ultrasound to diagnose the condition can put surgeons in a diagnostic and intraoperative dilemma. Currently there are no guidelines on how to manage cases of GBA.
Here we report the case of a 38 year old lady who presented with recurrent symptoms of biliary colic with normal blood results (including FBC, LFTs, U&E). She was initially diagnosed to have a contracted gallbladder (GB) with a stone on US and non-visualisation of GB on repeated US in different admissions. MRCP confirmed GBA with normal biliary tree. The patient was treated conservatively and her symptoms settled.
Discussion: GBA reported incidence is 0.013 to 0.075%. Female to male ratio is 3:1 and it often presents in the second and third decades.
Despite absence of GB, in almost a quarter of cases the patients present with biliary disease symptoms explained by biliary dyskinesia and Sphincter of Oddi dysfunction or CBD stones. The rarity of GBA, absence of specific symptoms or the clinical picture of biliary disease with failure of US to diagnose GBA, make it difficult to diagnose preoperatively and put the surgeon in a diagnostic and intraoperative dilemma. Historically all cases of GBA were diagnosed intra-operatively.
US frequently, falsely reveals contracted GB and sometimes non visualisation of GB. MRCP is considered the investigation of choice.
GBA represents a challenge during laparoscopic surgery. Iatrogenic damage can easily occur during dissection to find the absent GB, and the inability to pull on the GB increases this risk. In our case, MRCP allowed us to make a pre-operative diagnosis.
There are no specific guidelines on how to manage GBA cases. However the management is conservative with smooth muscle relaxants and sometimes sphincterotomy.
Conclusion: Due to lack of awareness of GBA the diagnosis remains a diagnostic challenge. Pre-operative MRCP or EUS should be considered in cases of US non visualisation of gallbladder, suspected ectopic GB, absence of WES Triad or double arc shadow to avoid unnecessary surgery and iatrogenic biliary injury.
Hepato-biliairy & pancreas—gallbladder
P128—The “golden week” for acute cholecystitis: experience from a “spoke” italian hospital
Giovanni Cestaro, F. Cavallo, M. Zese, D. Prando, F. Agresta
Ospedale Civile Di Adria, Uoc Chirurgia Generale, Italy
Aim: According the most recent Tokyo Guidelines (2018), the best therapeutic option for acute cholecystitis is represented by the surgical treatment within 72 h. In case of hepatic duct dilatation, an endoscopic procedure (Endoscopic Retrograde Cholangio – Pancreatography – ERCP) is recommended to do a preoperative adequate biliary drainage. We report our experience in the treatment of acute cholecystitis in a “spoke” Italian hospital.
Materials and Methods: We did a retrospective analysis about patients affected by acute cholecystitis and treated surgically from January 2019 to December 2019. We collected data about age, co-morbidities, timing of ERCP, timing of cholecystectomy, post-operative complications according Clavien-Dindo Classification at 1 month and 6 months. We analysed continuous data as the means (with SD and range). Categorical data were analysed as frequencies and percentages.
Results: We treated 47 patients, 21 males and 26 females, medium age 62,7 years old (range 41–83 years old). All patients presented at our Department of Surgery (Ospedale Civile di Adria – ULSS5 POLESANA) with acute outbreak of cholecystitis (abdominal pain, vomit, nausea, elevated leucocytes, elevated CRP, US or CT scan signs of cholecystitis). 19 patients presented significant co-morbidities: diabetes, hypertension, cardiac failure, hyperlipidaemia, hyperuricemia, atrial fibrillation, etc. 10 patients presented jaundice or biliary intrahepatic or biliary extrahepatic dilatation too, consequently we sent them to a “hub” hospital (Ospedale di Rovigo – ULSS5 POLESANA) to do an effective biliary drainage by ERCP and then, at same day, we performed cholecystectomy. All cholecystectomies were conducted laparoscopically within 1 week of symptoms beginning. All patients received antibiotics in perioperative period. Conversion rate: 0%. Post-operative complications in 2 patients, both Clavien-Dindo Grade 1, at 1-month follow-up.
Conclusions: In a “spoke” Italian hospital, there usually is a “limited” endoscopic activity characterized by an activity’s centralization in the “hub” hospital. In our case we need to book all ERCP in the “hub”, planning the exam once a week. We consider acute cholecystitis a life-threatening condition, especially in patients with co-morbidities. Our analysis demonstrated the key role of surgical laparoscopic treatment of acute cholecystitis, both in elderly patients with comorbidities and as soon as possible after ERCP. Laparoscopic cholecystectomy and ERCP are safe and feasible procedures within 1 week of acute cholecystitis diagnosis: we noticed an immediate relief from pathologic condition and discharge within 4 days after the treatment.
Hepato-biliairy & pancreas—gallbladder
P129—Readmissions after cholecystectomy in a Tertiary UK Center: incidence, causes and burden
Islam Omar1, A. Hafez2
1Sunderland Royal Hospital, South Tyneside and Sunderland NHS Trust, Bariatric Unit, Department of General Surgery, 2Gloucestershire Hospitals NHS Foundation Trust, Surgery, United Kingdom
Background: Although cholecystectomy is a widely performed procedure, postoperative readmissions place a heavy burden on healthcare facilities.
Objectives: This study assesses the incidence, causes and burden of 30-day readmissions after cholecystectomy in a tertiary UK center.
Methods: A retrospective cohort study was conducted on 30-day readmissions after cholecystectomy from 1 April 2018 to 31 March 2020. The preoperative data that was collected included age, gender, body mass index (BMI) and diabetes (DM) status. The operative data included mode of surgery, the admission rate from day-case surgery and the surgeon’s level. We studied the causes of readmission, investigations obtained and their findings, interventions required and the hospital stay on readmission.
Results: Out of the 1,140 cholecystectomies performed over this time, there were 75 true readmissions and 29 revisits; thus, the actual readmission rate is 6.58%. Non-specific abdominal pain ± deranged liver function tests (LFT) is the most common cause of readmission at (38;36.54%) cases, followed by (18;17.31%) wound infections and (12;11.54%) collections/bile leaks/abscess. This cost the center 93 scans; 30 procedures and 295 days of hospital stay.
Conclusion: Non-specific abdominal pain ± deranged LFT is the most common cause of readmissions/revisits in the center. Readmissions after a cholecystectomy are a significant encumbrance.

Table 1.
Breakdown of reasons for revisits and true readmissions

Hepato-biliairy & pancreas—gallbladder
P336—Acute Gallbladders during the COVID-19 Pandemic: District Hospital observational prospective study
Hatim Albirnawi, K. Hamed, B. Dent
Gateshead Foundation Trust, General Surgery, United Kingdom
Backgrounds: During the COVID-19 pandemic the recommendations from the Royal College of Surgeons in England advised against operating on all aerosol generating procedures to minimize the risk of COVID-19. From June 2020 we restarted our Emergency service for acute gallbladders after the introduction of smoke evacuation devices and wearing full protective personal equipments. The aim of study is to assess our Acute Gall Bladder Service during the COVID-19 Pandemic.
Methods: Prospectively, between June 2020 and November 2020, we collected all the patients admitted with primary biliary pathology including Biliary colic, Acute cholecystitis, Gall stones pancreatitis, and acute cholangitis. All Elective Laparoscopic cholecystectomies were excluded.
Results: The total number of patients were151. 77 (50.9%) had hot gallbladder with median age of 55 years. 74 (49%) have not had surgery. 28 ( 37.8%) were deemed unfit for surgery. 24 (32.4%) had no surgery because they require further investigations at tertiary center such as Endoscopic Ultrasounds, Endoscopic retrograde pancreatic-cholangiography. 10 patients (13.5%) refuses to have surgery.11 patients (14.8%) planned for elective procedure. 1 patient (1.35%) has been diagnosed with COVID-19 and hence procedure cancelled.
Conclusion: during the COVID-19 pandemic from June 2020 to November 2020 we managed to resume our acute gall bladder services by operating on 77 out of 151 patients (50.9%) within 7 days of hospital admission. No COVID related complications has been encountered among either patients nor healthcare providers.
Hepato-biliairy & pancreas—liver
P130—Surgical treatment of cirrhotic refractory ascites through cervical decompression of the thoracic lymphatic duct
Gheorghe Anghelici
State University of Medicine and Pharmacy “Nicolae Testemitanu”, Laboratory of Liver Surgery, Clinic “C. Tibirna”, Moldova
Introduction: The evolution of refractory ascites (RA) in decompensated liver cirrhosis (LC) is associated with hepatic lymph hyper production and central lymphodynamic blockage of the cervical segment of the thoracic lymphatic duct (TLD). The aim of this study was to evaluate the efficacy of the surgical decompression of TLD with reactivation of central lymph circulation in the management of RA in decompensated LC.
Materials and Methods: Over the period 2010–2020, 178 pts with LC and RA (Child B\C- 56/122, with a mean Child score of 10.8 ± 1.2) have been treated. The aim of the surgical decompression of the cervical segment was the reactivation of the central lymphatic flow and the restoration of the lymphatic drainage function on TLD. Surgical procedures applied included the extensive mobilization of the cervical segment of TLD with ligating of the confluent lymphatic branches and debridement of the cervical segment of TLD with intra-operative reactivation of the central lymphatic flow.
Results: The results of the treatment have been analyzed after one year post-surgery. No post-surgery deaths have been registered. Complete disappearance of ascites was established in 63 cases (35.4%). Regression and stabilization of ascites was registered in 59 cases (33.1%) in 3–4 months after the surgery. 39 patients (21.9%) required periodical laparocentesis – stabilization of ascites in these cases was noted in 5–6 months after the surgical decompression of TLD. Progressive hepato-renal failure and death occurred in 17 patients (9.6%) with decompensated LC (Child C score > 11).
Conclusion: The restoration of the lymphatic flow in TLD contributes to the augmentation of the trans-peritoneal lymph circulation and to the resorption of the ascites fluid. Hereby, cervical lymphatic decompression of the TLD is a pathogenetically validated method in the treatment of RA in LC. This method significantly improves post-surgery quality of life in patients with LC and RA.
Hepato-biliairy & pancreas—Liver
P131—Surgical mini-invasive correction of refractory ascites in patients with decompensated liver cirrhosis
Gheorghe Anghelici1, S. Pisarenko1, M. Gaidau2, T. Zugrav1, G. Lupu1, L. Lisnic2
1State University of Medicine and Pharmacy “Nicolae Testemitanu”, Laboratory of Liver Surgery, Surgery Clinic “C. Tibirna”, 2St. Trinity Municipal Hospital, Department of Imaging, Moldova
Introduction: The development of refractory ascites in liver cirrhosis significantly complicates its treatment. The evolution of cirrhotic ascites is strongly related to severe disturbances of lymph circulation and blockage of peritoneal absorption.
Objective: The aim of this study was to determine the most effective methods of surgical correction of refractory ascites in patients with decompensated liver cirrhosis through decompression of the cervical thoracic lymphatic duct and simultaneous laparoscopic sanitation with post-surgery fractional rinsing of the abdominal cavity.
Materials and Methods: From 2014 to 2020, 118 patients (65 men (55.1%) and 53 women (44.9%),) aged 28 to 73 underwent surgery for cirrhosis with massive refractory ascites Child C (9–10), without obvious signs of hepatic encephalopathy. The most significant etiological factors were, as follows: viral hepatitis C (51 patients (43.2%)), B (34 pts (28.8%)), B + D (23 pts (19.5%)), toxicity (10 patients (8.5%)). To prevent possible bleeding at the first stage, endoscopic filling of esophageal varices with fibrin glue was performed in 103 patients (87.3%). After testing the efficacy of varices filling, decompression surgery of the thoracic lymphatic duct was performed, in the following 5–7 days, under local anesthesia to improve lymphatic drainage from liver and abdominal organs. Simultaneously, laparoscopic sanitation of abdominal cavity was performed, with complete evacuation of the ascites fluid, rinsing and drainage. Fractional post-surgery rinsing was repeated daily for 3–5 days in order to remove peritoneum edema and restore its absorptive capacity. Evaluation of results was performed 3, 6 and 12 months after surgery, based on criteria of liver reserves and ascites volume.
Results: Immediate post-surgery mortality from liver failure was 5.1% (6 pts), with 7 other patients (5.9%) dying of the same cause in the following 3–6 months. The annual survival rate rose to 93.2%. Complete ascites regression over the course of 3–12 months post-surgery was registered in 58 patients (49.2%), and significant regression and stabilization was recorded in 35 cases (29.7%), while moderate regression with need for periodic decompressive laparocentesis was observed in 12 patients (10,2%). Both functional liver reserves and overall quality of life significantly improved in all patients.
Conclusion: Decompression of the thoracic lymphatic duct, combined with simultaneous laparoscopic sanitation of ascites and post-surgery fractional rinsing of the abdominal cavity, for refractory ascites correction in patients with liver cirrhosis has proved its efficacy and deserves becoming an establishment clinical practice.
Hepato-biliairy & pancreas—Liver
P133—Achievement of textbook outcomes and comparisons with benchmark values after laparoscopic hepatectomy
Mizelle D'Silva1, J.Y. Cho2, H.S. Han2, Y.K. Yoon2, H.W. Lee2, J.S. Lee2, B. Lee2, M.H. Kim2
1Jaslok Hospital and Research Centre, Gastrointestinal Surgery, India. 2Seoul National University Bundang Hospital, General Surgery, Korea
Background: Laparoscopic left lateral sectionectomy(LLLS) is considered a standard approach for patients. Textbook outcomes(TOs) with benchmark values have been developed to help centers assess their outcomes of LLLS. Our objective was to apply the published benchmark values to LLLS performed at our center, and to compare our TOs with those of other centers.
Methods: This is a retrospective cohort study including 195 patients undergoing LLLS between January 2004 and December 2018. Our outcomes were compared with benchmark values and graded as similar, better, or worse.
Results: A TO was achieved in 106 patients (54.4%). The main determinant for achieving a TO was prolonged hospital stay. Year of surgery (P = 0.011; odds ratio[OR] 3.157, 95% confidence interval [CI] 1.302–7.652) and American Society of Anesthesiologists score (P = 0.021; OR 0.192, 95% CI 0.032–1.170) were the only factors associated with achieving a TO. (Table 1) Our outcomes were similar to the benchmark values for all criteria, expect for the transfusion rate (our study vs benchmark values; 6.2% vs 3.8%), which was worse in our patients. We achieved better outcomes with a lower conversion rate (4.6% vs 7.2%), fewer patients requiring massive transfusion (4.1% vs 8.3%), lower rate of prolonged inflow clamping (3.9% vs 6.3%), lower overall complication rate (11.9% vs 19.8%), lower reoperation rate (0% vs 3.4%), and fewer patients with a positive margin (1.5% vs 10.8%). (Table 2).
Table 1.
Multivariable analysis of factors associated with textbook outcomes in patients who underwent laparoscopic left lateral sectionectomy
| P value | Odds ratio | 95% CIa | |
|---|---|---|---|
| Year of surgery | 0.011 | 3.157 | 1.302–7.652 |
| ASAb score | 0.073 | 0.192 | 0.032–1.170 |
aCI confidence interval
bASA American Society of Anesthesiologists.
Multivariable analysis with bootstrapping.
Table 2.
Comparison of outcomes between our center and benchmark values
| Benchmark value | Our value | Meeting benchmark | |
|---|---|---|---|
| Conversion | ≤ 7.2% | 9 (4.6) | Better |
| Blood loss (mL) | ≤ 150 | 200 (100–362.5) | X Same |
| Blood loss > 500 mL | ≤ 19.4% | 33 (16.9) | Same |
| Massive blood loss | ≤ 8.3% | 8 (4.1) | Better |
| Operative time (min) | ≤ 205 | 160 (120–235) | Same |
| Inflow clamping > 40 min | ≤ 6.3% | 8 (3.9) | Better |
| Transfusion | ≤ 3.8% | 12 (6.2) | X worse |
| Mortality | ≤ 1.2% | 2 (1.0) | Same |
| Complications | ≤ 19.8% | 23 (11.9) | Better |
| Severe complications | ≤ 5.3% | 10 (5.1) | Same |
| Liver-related complications | ≤ 3.6% | 7 (3.6) | Same |
| Bile leakage | ≤ 1.9% | 3 (1.5) | Same |
| Postoperative ascites | ≤ 3.4% | 6 (3.1) | Same |
| Reoperation | ≤ 3.4% | 0 | Better |
| LOSa | ≤ 6 days | 6 (5–8) | Same |
| No negative margin | ≤ 10.8% | 1/69 (1.5) | Better |
| No TO b | ≤ 54.4% | 89 (45.6) | Same |
Values are median (range) or n (%) of patients
aLOS length of stay
bTO textbook outcome
Conclusion: TOs are useful tools to measure the surgical outcomes and compare surgical performance with benchmark values. TOs also offer a new method to retrospectively compare outcomes.
| Bootstrap P value | Bootstrap 95% CIa | |
|---|---|---|
| Year of surgery | 0.010 | 0.268–2.285 |
| ASAb score | 0.021 | − 22.074 to − 0.072 |
aCI, confidence interval; b ASA, American Society of Anesthesiologists.
Hepato-biliairy & pancreas—Liver
P134—Evolution of laparoscopic liver surgery: over 20-year experience of the Norwegian high-volume referral center
Davit Aghayan1, A. Kazaryan3, Å. Fretland1, B. Røsok2, L. Barkhatov4, K. Lassen2, B. Edwin1
Oslo University Hospital, 1The Intervention Centre, 2Department of HPB Surgery, 3Østfold hospital trust, Department of Gastrointestinal Surgery, 4Haukeland University Hospital, Department of Gastrointestinal Surgery, Norway
Background: Laparoscopic liver surgery has evolved and become a standard surgical approach in many specialized centers worldwide. In this study we present the evolution of laparoscopic liver surgery at a single high-volume referral center since its introduction in 1998.
Materials and methods: Patients who underwent laparoscopic liver resection between August 1998 and December 2018 at the Oslo University Hospital were identified. Perioperative outcomes were compared between three time periods: early (1998 to 2004), middle (2005 to 2012) and recent (2013–2020).
Results: In total 1232 procedures were performed during the 20-years period. Colorectal liver metastasis (CRLM) was the main indications for surgery (68%), while hepatocellular carcinoma (HCC) was the indication in 7% and intrahepatic cholangiocarcinoma (ICC) in 1.5%. The rate of conversions to laparotomy and hand-assisted laparoscopy were 3.2% and 1.4%. The median operative time and blood loss were 130 (interquartile range, 85–190) min and 220 (interquartile range, 50–600) ml, respectively. The total postoperative complications rate was 20.3% and the perioperative 30-days mortality was 0.3%. The median postoperative stay was 2 (interquartile range, 2–4) days. The 5-year overall survival for patients with CRLM who primarily underwent laparoscopic liver resection was 49%, for HCC 55% and for ICC 44%.
When comparing perioperative outcomes between three time periods, shorter operation time (median, from 182 to 120 min, p- < 0.001), less blood loss (median, from 550 to 200 ml, p-0.023), decreased rate of conversions to laparotomy (from 8 to 3%) and shorter postoperative hospital stay (median, from 3 to 2 days, p- < 0.001) was observed in the later periods, while the number of more complex liver resections had increased.
Conclusion: During the last two decades, the indications, the number of patients and the complexity of laparoscopic liver procedures have been expanded significantly. Initially being an experimental approach, laparoscopic liver surgery has now become the method of choice for various liver tumors at our institution.
Hepato-biliairy & pancreas—Liver
P135—Comparison of immediate outcomes of hydro-jet dissector and ultrasonic surgical aspirator in laparoscopic liver resection
Ivan Kazakov, M.E. Efanov, R.B. Alikhanov, A.N. Vankovich, A.A. Koroleva, D.A. Salimgireeva, V.V. Tsvirkun
The Loginov Moscow Clinical Scientific Center, HPB, Russia
Aim: Comparison of immediate outcomes of hydro-jet dissection and ultrasonic surgical aspirator in liver parenchyma transection during laparoscopic resection in a prospective randomized single-center study.
Methods: Patients with benign and malignant tumors were consecutively enrolled in the study. The primary point was the estimation of blood loss. Secondary points included duration of liver transection, morbidity, hospital stay.
Results: Totally 68 patients were enrolled in the study with 34 patients included in each group. There were no differences between groups in the difficulty of resection (according to IWATE criteria and IMM score) and other basic surgical parameters. No differences were found in all primary and secondary points except the expenditure. The cost of disposal equipment was significantly higher in the group of ultrasonic aspirator.
Conclusion: Hydro-jet and ultrasonic surgical aspirator have similar efficacy and safety in liver parenchyma transection during laparoscopic resection.
Hepato-biliairy & pancreas—Liver
P137—Microcatheter technique as a method of preventing complications in chemoembolization of liver arteries
Elena Zvezdkina1, D.P. Lebedev2, A.G. Kedrova2, Yu.A. Stepanova3, D.A. Astakhov4, D.N. Panchenkov4
1State Scientific Center of Laser Medicine named after O.K. Skobelkin of the Federal Medical and Biological Agency of Russia, 2Federal Research Clinical Center for Specialized Types of Health Care and Medical Technologies of Federal Medical and Biology A, X-ray endovascular diagnostics and treatment, 3Vishnevsky National Medical Research Center for Surgery, Moscow, Russian Federation, Directorate, Scientific Secretary, 4Evdokimov Moscow State University of Medicine and Dentistry, Moscow, Russian Federation, Surgery, Russia
Aim: The aim of the study was to evaluate changes in surgical technique and the role of imaging methods in the prevention of complications after transcatheter arterial chemoembolization of liver arteries using drug-eluting beads (DEB-TACE).
Methods: This study included 34 patients who underwent 52 DEB-TACE with drug-saturated microspheres with a working diameter of 200–400 µm. The primary tumors were: colon (n = 14), pancreas (n = 5), stomach (n = 2), prostate (n = 2), lung (n = 2), hepatocellular cancer (n = 2), cancer of the small intestine, rectum, ovaries, uterine body, breast, oropharynx, cholangiocarcinoma (n = 1, respectively). The studied patients had the following types of liver damage: bilobar multiple focal liver damage (n = 27), a single large focus (n = 4), multiple tumors with an infiltrative growth pattern along the bile ducts (n = 3) (parabiliary metastases of colorectal cancer and cholangiocarcinoma). We performed superselective catheterization of targeted tumor arteries with a microcatheter and administration of sufficient of drug-saturated microspheres with doxorubicin or irinotecan until the control point was reached. The follow-up period ranged from 6 months to 5 years. Computed Tomography (CT) and Magnetic Resonance Imaging (MRI) with bolus contrast enhancement were performed for follow-up and if complications were suspected.
Results: Intraoperative complications such as spasm of arteries, their dissection, occlusion, rupture have never been encountered in DEB-TACE using micro-catheter technique. We also avoided non-target embolization in the presence of pronounced collaterals and arteriovenous fistulas. The physical health of 14 patients suffered within 1–2 months after DEB-TACE and we performed CT and MRI. According to the imaging, 9 patients had cholangitis. In 6 cases, the revealed changes regressed after hepatoprotective therapy. 1 patient appeared multiple bilomas and abscesses along the bile ducts, which regressed for 3 months of nonsurgical treatment. In 1 case, necrosis of the liver parenchyma formed at the site of cholangitis. All 3 patients had previous reconstructive operations on the bile ducts.
Conclusion: The modification of the surgical approach and use micro-catheters made it possible to avoid complications from the vascular wall and non-target embolization. Complications from the bile ducts have stages that can be diagnosed on CT and MRI and prevent the further development of the process.
Hepato-biliairy & pancreas—Liver
P138—An integrated approach to the prevention of complications of transcatheter arterial chemoembolization of liver arteries
Dmitry Astakhov, Russia
Aim: The aim of the study was to evaluate changes in surgical technique and the role of imaging methods in the prevention of complications after transcatheter arterial chemoembolization of liver arteries using drug-eluting beads (DEB-TACE).
Methods: This study included 34 patients who underwent 52 DEB-TACE with drug-saturated microspheres with a working diameter of 200–400 µm. The primary tumors were: colon (n = 14), pancreas (n = 5), stomach (n = 2), prostate (n = 2), lung (n = 2), hepatocellular cancer (n = 2), cancer of the small intestine, rectum, ovaries, uterine body, breast, oropharynx, cholangiocarcinoma (n = 1, respectively). The studied patients had the following types of liver damage: bilobar multiple focal liver damage (n = 27), a single large focus (n = 4), multiple tumors with an infiltrative growth pattern along the bile ducts (n = 3) (parabiliary metastases of colorectal cancer and cholangiocarcinoma). We performed superselective catheterization of targeted tumor arteries with a microcatheter and administration of sufficient of drug-saturated microspheres with doxorubicin or irinotecan until the control point was reached. The follow-up period ranged from 6 months to 5 years. Computed Tomography (CT) and Magnetic Resonance Imaging (MRI) with bolus contrast enhancement were performed for follow-up and if complications were suspected.
Results: Intraoperative complications such as spasm of arteries, their dissection, occlusion, rupture have never been encountered in DEB-TACE using micro-catheter technique. We also avoided non-target embolization in the presence of pronounced collaterals and arteriovenous fistulas. The physical health of 14 patients suffered within 1–2 months after DEB-TACE and we performed CT and MRI. According to the imaging, 9 patients had cholangitis. In 6 cases, the revealed changes regressed after hepatoprotective therapy. 1 patient appeared multiple bilomas and abscesses along the bile ducts, which regressed for 3 months of nonsurgical treatment. In 1 case, necrosis of the liver parenchyma formed at the site of cholangitis. All 3 patients had previous reconstructive operations on the bile ducts.
Conclusion: The modification of the surgical approach and use micro-catheters made it possible to avoid complications from the vascular wall and non-target embolization. Complications from the bile ducts have stages that can be diagnosed on CT and MRI and prevent the further development of the process.
Hepato-biliairy & pancreas—Liver
P139—Simultaneous laparoscopic liver resection or radiofrequency ablation by single-port approach during elective loop-ileostomy closure
Jean-Marc Regimbeau, Jeanne Dembinski, A. Pellegrin, K. Allart, C. Sabbagh
Amiens University Hospital, Department of Digestive Surgery, France
Background: To report on the feasibility, the morbidity and the mortality of a novel strategy for patients undergoing loop-ileostomy closure for colorectal cancer with synchronous treatment of colorectal cancer liver metastases (CRCLM).
Methods: The strategy consisted of laparoscopic liver resection (LLR) or radiofrequency ablation (LRFA) of CRCLM by a single-port approach and a simultaneous elective loop-ileostomy closure. All consecutive patients who underwent this strategy were included. Short-term and middle-term results and the patient’s perioperative satisfaction were recorded.
Results: Between 2017 and 2019, five patients with CRCLM were treated according to this strategy. The feasibility was 100%. The overall morbidity was 20% (n = 1, postoperative ileus) and the mortality was 0%. The CRCLM were treated by wedge resection (n = 3) or LRFA (n = 3). The mean blood loss was 70–116.6 mL 300–50. The mean operating time was 168–52.3 [100–220] minutes. The mean LOS was 3.5 ± 1.4 days [2–5]. The average EVAN G score was 83.3% [70–95] showing a global satisfaction of the patients on the perioperative course. The rate of R0 resection was 80% and the rate of local recurrence was 20%. The 2-years overall survival rate was 84% (n = 4). At the end of follow-up, the rate of incisional hernia was 0%.
Conclusions: This mini-invasive approach appears to be feasible, safe and useful for patients.
Hepato-biliairy & pancreas—Liver
P141—A rare case of subcapsular haematoma following laparoscopic cholecystectomy
Ben Tudor-Green1, P. Christopoulos2, K. Bowling2
Torbay Hospital, 1General Surgery, 2Upper Gastrointestinal Surgery, United Kingdom
Introduction: Laparoscopic cholecystectomy is considered the gold standard for the management of symptomatic gallstone disease. Over the last twenty years, there has been a significant reduction in post-operative morbidity, mortality and hospital stay to the extent that the majority of cases are done on day case surgical lists. However, awareness is still required for complications may arise.
Method: A 68-year-old gentleman presented for elective day case laparoscopic cholecystectomy for recurrent cholecystitis. Patient’s medical background included; chronic lymphocytic leukaemia-on ibrutinib and asthma. The procedure was complicated with considerable bleeding from the liver bed but was controlled with cauterize and haemostatic gauze. The patient was discharged the next day but presented at day 6 post-operatively with fever, abdominal wall bruising together with a raised CRP. The Computer Tomography scan showed a collection at the gallbladder fossa but also, surprisingly, a large intrahepatic subcapsular haematoma (13 cm × 10 cm) in the right lobe of the liver.
Results: The patient had an ultrasound-guided drainage of the gallbladder fossa haematoma by Interventional Radiology. The unit’s decision was to treat the subcapsular haematoma conservatively and he was discharged 5 days post-drainage with long term antibiotic cover as per microbiology guidance. A month later the patient remains well and haemodynamically stable.
Conclusion: Subcapsular haematoma after laparoscopic cholecystectomy is a rare but serious complication which could be expected in patients with haematological diseases. Management is individualized and depends mainly from the size and the haemodynamic instability of the patient.
Hepato-biliairy & pancreas—Liver
P142—Post ERCP subcapsular hepatic hematoma: therapeutic options in a rare complication
Carlos F. Fernández Mancilla, M. Mella Laborde, F. Ivorra Muñoz, M. Morales Calderón, A.F. Compañ Rosique
San Juan Hospital, General Surgery, Spain
Aims: Subcapsular hepatic hematoma is an exceptional complication after ERCP is performed.
The clinical management of these patients will be conditioned by their hemodynamic stability, being conservative in most cases. Angioembolization can be considered. Otherwise, we will opt for an emergency surgical treatment. The aim of the study is to describe a case report and review of the literature.
Methods: Search in Pubmed and Tripdatabase using the term “Subcapsular Hepatic Hematoma Post-ERCP”.
Results: We present a case of a 60-year-old woman with no relevant medical history was electively operated on for cholelithiasis. Previously, ERCP plus sphincterotomy was performed for choledocholithiasis. After the initial laparoscopic approach, it was converted to an open approach when finding stones in the main bile duct. A choledochotomy was performed and six stones were extracted using a Fogarty catheter. Subsequently, choledocorrhaphy was performed on a Kher tube plus cholecystectomy. On the 8th postoperative day, a trans Kher cholangiography was performed, which reported residual choledocholithiasis. The new ERCP revealed an unstructured papilla and bile duct dilation with three filling defects. A sphincteroplasty was performed with a 12 mm radial expansion balloon together with a Fogarty balloon, and 4 choledocholithiasis were removed. At 24 h after the procedure, the patient presented diffuse abdominal pain for which an abdominal CT scan was requested (Fig. 1), which reported a right subcapsular hepatic hematoma of 34 mm (thickness) × 154 mm (diameter) × 191 mm (diameter of the caudal skull). The patient was transferred to the ICU for control. A week later, he presented progressive anemization and oliguria, which is why a new CT scan was performed, which reported a hematoma with signs of acute bleeding without identifying a specific active bleeding point associated with peri splenic and peri gastric hemoperitoneum. The Interventional Radiology Service was contacted, and an arteriography was performed with embolization of the right hepatic segmental branches and drainage of the intra-abdominal collection. Five days later, he presented an episode of hemodynamic instability in relation to active splenic bleeding with associated hematoma and an urgent splenectomy was performed. Later the patient evolved satisfactorily until being discharged 30 days after admission.
The case reports described in the worldwide literature, is just only thirty (Fig. 2). Of these, a total of thirty three procedures were performed; 13 patients (39.3%) evolved satisfactorily with conservative treatment, 8 (24.2%) required percutaneous drainage due to overinfection of the hematoma, 6 cases (18.1%) were treated by embolization and 6 patients (18.1%) required surgery. Of the total number of patients, 2 underwent urgent surgical treatment due to angioembolization failure and, in turn, one of them required percutaneous drainage.
Conclusion: 1. In the most of cases, the management is a conservative option.
2. Angioembolization procedure, may be a therapeutic option when patient present an active bleeding and hemodynamic stability.
3. When hematoma is infected, percutaneous drainage could be indicated (Table 1).
Table 1.
.

Hepato-biliairy & pancreas—pancreas
P144—Pancreatoduodenectomy in obese patients: morbidity, mortality and failure to rescue
Anthony Di Gioia, T. Giuliani, G. Marchegiani, R. Salvia, C. Bassi
G.B. Rossi Hospital, General and Pancreatic Surgery, Italy
Purpose: To evaluate the postoperative outcomes of obese patients undergoing pancreatoduodenectomy (PD) and identify preoperative predictors of mortality and failure to rescue (FTR).
Methods: All patients undergoing elective PD for 10 consecutive years till 2019 were included. Patients were divided into two groups according to their BMI and analyzed. Obesity was defined as BMI ≥ 30 kg/m2.
Results: The study population consisted of 1865 patients, of whom 151 were obese (8.1%). Overall mortality and FTR were 3.1% and 14.1%, respectively. Postoperative pancreatic fistula (POPF; 35.8% vs. 25.8%), postpancreatectomy acute pancreatitis (PPAP; 24.2% vs. 12.5%), and chyle leak (CL; 5.9% vs. 3.2%) were more frequent among obese patients. In obese patients, mortality was 6.0% and FTR 26.5%. At multivariable analysis, obesity as BMI ≥ 30 kg/m2, age > 70 years, and American Society of Anesthesiologists—Performance Status (ASA-PS) score were independent predictors of mortality and FTR. In the subgroup of patients with non-malignant periampullary tumors (n = 443), obesity was the only independent predictor of FTR.
Conclusion: Pancreatoduodenectomy performed in obese patients was associated with higher surgical morbidity and mortality. When dealing with non-malignant periampullary tumors, deferring surgery in obese patients should be strongly considered.
Hepato-biliairy & pancreas—pancreas
P145—The effectiveness of fish mouth suture of pancreatic stump for pancreatic leakage by Shuriken shaped umbilicoplasty method in the lap-DP
Yoshinobu Sato, T. Matsumura, A. Obana, K. Karikomi, M. Koyama, S. Usui, N. Koide, K. Kitamura, K. Iwasaki, T. Suwa
Kashiwa Kosei General Hospital, Hepato-Biliary Pancreatic Transplant Surgery, Japan
Background: Pancreatic leakage(PL) has been reported about 30% to 40% in distal pancreatectomy(DP) with automatic suture instrument (ASI). Almost of closure of pancreatic stump(PS) have been made by ASI In laparoscopic DP (LDP), therefore, there no any studies about the comparison of PL between handmade fish mouth suture(FMS) and ASI of pancreatic stump.
Aim: We already reported the laparoscopic surgery by Shuriken shaped umbilicoplasty method (SSUPM), which could do laparoscopically handmade fish mouse suture of PS. In this study, we examined about the comparison of PL between handmade fish mouse (FM) suture and ASI suture of PS int the laparoscopic DP.
Materials and Methods: Fifteen patients underwent LDP by SSUPM from 2019 May to 2021 March in our hospital for pancreatic diseases. Average of patient`age was 66.7 ± 11.7 (male/female: 7/8). They were divided two groups. The first was done sutured PS by ASI (n = 10), and the other was by handmade FMS (n = 5). We examined about the frequency of early pancreatic leakage, delayed postoperative pseudo-pancreatic cyst, operative time, operative bleeding, and hospital stay in the two groups. The all statistical analyses were performed with EZR (windows version 3.25). The pseudo-pancreatic cyst was estimated abdominal CT within 4 month after discharge from hospital.
Results: The operative time of ACI and FMS group were 316 ± 46 and 280 ± 49 (p = 0.399)relatively. The operative bleedings were 134 ± 108 ml and 194 ± 338 ml (p = 0.608)respectively. The hospital stay were 11.7 ± 5.4 and 14 ± 9.5 (p = 0.832) respectively. The frequency of early operative PL of two groups were 30%(3/10) and 0% (0/5) (p = 0.081) respectively, and the delayed pseudo-pancreatic cyst were 50% and 30% (p = 0.015)respectively.
Conclusions: There were no any significant differences in the operation time, operative bleeding and the hospital stay. However, the frequency of delayed postoperative pseudo-pancreatic cyst of ASI was more than that of FMS with statistical significance (p = 0.015). Moreover, the frequency of early PL of ASI tended to be also more than that of FMS (p = 0.081). In this study, the FMS by Shrunken shaped umbilicoplasty might be effective surgical procedure compared for preventing PL compared with ASI at the Lap-DP.
Hepato-biliairy & pancreas—pancreas
P146—Robotic assisted pancreatic enucleation. Clinical outcomes and cost effectiveness analysis
Valentina Ferri1, Riccardo Caruso1, Y. Quijano1, E. Vicente1, H. Duran1, E. Diaz1, I. Fabra1, L. Malave1, P. Ruiz1, G. De Nobili2, V. Nola3, V. Ferri1
1Hm Sanchinarro University Hospital, General Surgery, Spain. 2Chieti University, General Surgery, 3Pavia University, General Surgery, Italy
Background and Aims: We performed a prospective comparative study of robotic enucleation (RE) and open enucleation (OE) at our centre with the aim of evaluating clinical and cost-effective outcomes.
Study Design: This is a comparative prospective non-randomized study which includes patients that underwent RE and OE reaching a minimum of 15 months of follow up from February 2010 to March 2018, at the Sanchinarro University Hospital, Madrid. Demographics, pathological characteristics, perioperative outcome, and medium term follow-up were collected. Surgical and post-operative costs, quality adjusted life years (QALY), and incremental cost per QALY gained, or the incremental cost effectiveness ratio (ICER) were calculated and compared in RE and OE goups. A willingness-to-pay of 20,000 € and 30,000 € per QALY was used as a threshold to recognize which treatment was most cost-effective.
Statistical analysis: Data has been recorded in a SPSS Statistics Version 20.0 database. To compare the means of the quantitative variables when the variables followed a normal distribution, a variance analysis and a Student’s t-test were used. For the rest of the variables, both Mann–Whitney andKruskal–Wallis tests were performed. Statistical significance was defined as having a P value of < 0.05. A sensitivity analysis was carried out in order to propagate the uncertainty of the estimations to the results of the model. We use a multivariate and stochastic sensitivity analysis performed by 5,000 Monte Carlo simulations. The cost-effectiveness plane was used to represent all pairs of solutions of the model. We also computed a cost-effectiveness acceptability curve which plots the probability that the RRR was cost-effective relative to LRR over a reasonable range of levels of willingness-to-pay. A willingness-to-pay of 20,000 € and 30,000 € per QALY was used as a threshold to recognize which treatment was most cost-effective.
Results: A total of 20 RE and 20 OE have been included. The overall rate of pancreatic leak was 27.7% in the RE group and 29.4% in the OE group (p > 0.5). The mean number of hospital stay days was significative higher in the OE (8.9 days vs 10.9 days, p = 0.03). The mean operative time was higher in the RE group.
The overall mean total cost was similar in both groups (RE: 5432.15 € versus OE: 4562.68 €; P > 0.5). Mean QALYs at 1 year for RE (0.652) was higher than that associated with OE (0.59) (p > 0.5). At a willingness-to-pay threshold of 20,000 € and 30,000 €, there was a 88.5% to 90.1% probability that RE was cost-effective relative to OE.
Discussion: Cost-effectiveness analysis is paramount whenever a new technology is introduced. For the first time in literature we assess the cost effectiveness of robot versus laparoscopy pancreatic enucleation and this study might stimulate further larger, randomized studies.
Conclusion: RE offers better postoperative outcomes with respect to the open resection and this study provides data of cost-effectiveness between the RE and OE approaches showing a benefit for RE.
Hepato-biliairy & pancreas—pancreas
P147—Towards zero postoperative pancreatic fistula: a propensity score matching analysis of pancreatic stump closure with radiofrequency vs stapler
Eva María Pueyo-Périz1, C. Téllez-Marquès1, A. Radosevic2, O. Morato1, L. Visa3, L. Izarbe4, E. Berjano5, E. De Vicente6, I. Poves1, L. Grande1, B. Burdío1, P. Sánchez-Velázquez1
Hospital del Mar, 1HepatoPancreaticoBiliary, 2Radiology, 3Oncology, 4Digestology, 5Universitat Politècnica de València, Department of Electronic Engineering, 6Hospital de Sanchinarro, HepatoPancreaticoBiliary, Spain
Objective: To demonstrate the efficacy of radiofrequency for pancreatic stump closure in reducing the incidence of postoperative pancreatic fistula (POPF) in distal pancreatectomy (DP) compared with mechanical transection methods.
Background: Despite all the different techniques of pancreatic stump closure proposed for DP, best practice for avoiding POPF remains an unresolved issue.
Methods: DP was performed in a cohort of patients by applying radiofrequency to stump closure (RF Group) and compared with mechanical closure (Control Group). A propensity score (PS) matched cohort study was carried out to minimize bias from nonrandomized treatment assignment. Cohorts were matched by PS accounting for factors significantly associated with either undergoing RF transection or mechanical closure through logistic regression analysis. The primary end-point was the incidence of clinically relevant POPF (CR-POPF).
Results: Of 89 patients included in the whole cohort, 13 case patients from the RF- Group were 1:1 matched to 13 control patients. In both the first independent analysis of unmatched data and subsequent adjustment to the overall propensity score-matched cohort, a higher rate of CR-POPF in the Control Group compared with the RF-Group was detected (25.4% vs. 5.3%, p = 0.049 and 53.8% vs. 0%; p = 0.016 respectively). The RF Group showed better outcomes in terms of readmission rate (46.2% vs 0%, p = 0.031). No significant differences were observed in terms of mortality, major complications (30.8% vs 0%, p = 0.063) or length of hospital stay (5.7 vs 5.2 days, p = 0.89).
Conclusion: Findings suggest that the RF-assisted technique is more efficacious in reducing CR-POPF than mechanical closure.
Hepato-biliairy & pancreas—pancreas
P148—Evaluation of an enhanced recovery program for outcome improvement after pancreaticoduodenectomy: a retrospective cohort study
Ann-Sophie Hufkens, Stijn van Cleven, Luis Abreu de Carvalho, Aude Vanlander, Frederik Berrevoet
Ghent University Hospital, Department of General and Hepatobiliary Surgery and Liver Transplantation, Belgium
Aims: The introduction of the Enhanced Recovery After Surgery (ERAS) protocol after pancreaticoduodenectomy (PD) has led to a reduction in hospital stay (LOS) without compromising surgical outcome. The primary endpoint of this study is to evaluate the adherence to postoperative targets of the ERAS protocol, and to describe short-term surgical outcomes. The secondary endpoints are 30-day readmission rate, reoperation rate and mortality.
Methods: This single centre retrospective analysis reviews all data of patients who underwent a PD in our tertiary referral hospital between August 2016 and December 2019. A total of 170 patients were operated of whom 154 patients were enrolled in the ERAS protocol. As per ERAS protocol, epidural analgesia was stopped on postoperative day (POD)2, nasogastric tube (NGT) removed on POD3, regular food tolerated by POD5. Drains were removed on POD2 and POD3, the soft drain along the pancreatic anastomosis between POD3-10.
Results: Epidural analgesia was removed on POD2 in 26 patients (17.7%), NGT removed on POD3 in 74 patients (49.0%), regular food tolerated by POD5 in 52 patients (34.9%). The lateral drain was removed in 81 patients (52.9%) on POD2, the medial drain in 39 patients (26.2%) on POD3, the soft drain in 95 patients (61.7%) between POD3 and 10. Nine patients (5.8%) had post-pancreatectomy haemorrhage (PPH), 14 (9.1%) postoperative pancreatic fistula grade B or C (POPF), 5 (3.3%) bile leakage, and 44 (28.6%) delayed gastric emptying (DGE). The 30-day readmission rate was 8.4%, reoperation rate 10.4%, and the in-hospital mortality 1.3%.
Conclusions: The adherence to targets of the ERAS protocol was found to be rather low. Biliary leakage, POPF, DGE, and PPH all led to an adapted ERAS protocol with prolonged LOS. Most complications were detected along the ERAS pathway, indicating that also patients at high risk for complications can be safely included in the ERAS protocol.
Hepato-biliairy & pancreas—pancreas
P150—Laparoscopic Spleen Preserving Distal Pancreatectomy with Preservation of the Splenic Vessels
Hamai Kenta, H. Kazuki, M. Jun, K. Hirohisa, K. Kazuyuki
Kurashiki Central Hospital, General Surgery, Japan
Background: Laparoscopic spleen-preserving distal pancreatectomy (LSPDP) is undertaken in patients with benign or low-grade malignant tumors located at the body or tail of the pancreas. The two main surgical techniques that have been proposed for LSPDP are the Kimura and Warshaw techniques. We perform the Kimura technique with preservation of the short gastric arteries and left gastroepiploic artery. When this technique is not feasible because of bleeding from the splenic vessels, we transect the splenic vessels and covert to the Warshaw technique.
Aims: LSPDP is less invasive than laparoscopic distal pancreatectomy with splenectomy, but there are few reports regarding its safety. This study aimed to evaluate the feasibility and safety of LSPDP.
Methods: The data of 3 patients who underwent LSPDP between August 2018 and August 2019 were retrospectively analyzed.
Results: The postoperative pathological diagnoses of the 3 patients were mucinous cystadenoma, solid-pseudopapillary neoplasm, and metastatic pancreatic cancer from renal cell carcinoma. The Kimura technique was performed in all patients, and there were no conversions to the Warshaw technique. The mean operation time was 332 min (range 201–520 min), the mean blood loss was 138 g (range 0–415 g), and the mean hospital stay was 7.3 days (range 6–9 days). The only postoperative complication was 1 case of biochemical leak according to the 2016 update of the International Study Group for Pancreatic Surgery definition.
Conclusion: Our technique for LSPDP was feasible and safe.
Hepato-biliairy & pancreas—pancreas
P151—The effect of ulinastatin on the severe acute pancreatitis in obese patients
Olha Tkachuk1, Andriy Kebkalo1, A. Kebkalo1, A. Chanturidze2, V. Tyselskyi1
1Shupyk Nacional Medical Academy of Postgraduate Education, Surgery and Proctology, 2Kyiv Regional Clinical Hospital, Surgery, Ukraine
Introduction: Obesity is a problem of the third millennium. It is known that obesity is a major factor in the development of various diseases, including acute pancreatitis. Obesity itself is a pro-inflammatory condition with elevated levels of the following pro-inflammatory cytokines: tumor necrosis factor (TNF-a), interleukin (IL) IL-10, IL-6, IL-1b. Acute pancreatitis is also a disease based on the pathogenesis of the cytokine reaction and autolysis. Thus, against the background of the already formed inflammatory response, the inflammatory response intensifies and increases, and the level of pro-inflammatory cytokines reaches critical values.
The purpose is to study the effect of ulinastatin on the severe acute pancreatitis in obese patients.
Methods: To refute or confirm the hypothesis among patients with severe acute pancreatitis and obesity (BMI was 37.48 ± 2.19 kg / m2), two groups were randomized. In the first group of 18 patients, a step-up approach was performed. In the second group, the total number of which was 18 patients, a standard treatment algorithm (control) was performed. The experimental group suggested the use of early resuscitation with Ringer's lactate and ulinastatin in the first 5 days of the disease. The drug was administered at a dose of 200,000 IU by intravenous infusion for 1 h 3 times a day for 5 days. In the control group, resuscitation was performed with 0.9% sodium chloride solution without the use of ulinastatin.
Hypothesis was tested by monitoring procalciton and C-reactive protein, interleukin-1 and interleukin-6 over a period of 24 h, 48 h, 10 days, 15 days, 30 days, 45 and 60 days. The choice of procalcitonin and CRP was made by calculating the relative risk, as the level of CRP > 200 mg / l indicated the preservation of severe disease (RR = 2.07; 95% CI = 1.65–2.59; p = 0.01), and an increase in procalcitonin > 1.8 ng / mg was a predictor of infection (RR = 2.27; 95% CI = 1.083–4.769; p = 0.02).
Results: The use of ulinastatin during the first 5 days in the experimental group reduced the level of interleukin-1 from 23.64 ± 4.13 to 8.71 ± 2.49 pg / ml (p = 0.001; α = 0.05), interleukin- 6—from 29.72 ± 4.27 to 12.43 ± 2.36 pg / ml (p = 0.001; α = 0.05). The use of resuscitation with Ringer's lactate solution in combination with ulinastatin for 5 days helped to reduce the level of procalciton in 1.8 times (2.89 ± 0.88 compared with 1.8 ± 0.23 ng / mg; p = 0.001; α = 0.05). The level of CRP during the period of ulinastatin decreased by 41.68 (267.28 ± 114.11 compared with 225.6 ± 84.9 mg / l; p = 0.01; α = 0.05). In-hospital mortality was significantly lower in the ulinastatin group (16% vs. 69.6%; p = 0.0003; α = 0.05). Significantly lower proportion of patients (24% compared to 73.9%; p = 0.0005; α = 0.05) with multiple organ failure among the study group. Organ dysfunction was acquired on day 5 among patients taking ulinastatin. The length of hospital stay was 49.7 ± 4.2 bed-days, while in the comparison group—56.67 ± 5.84 bed-days (p = 0.01; α = 0.05).
Conclusions: The use of Ringer-lactate early resuscitation in combination with ulinastatin has improved the treatment of severe acute pancreatitis in obese patients.
Hepato-biliairy & pancreas—pancreas
P152—Outcomes in early versus later endoscopic drainage in pancreatic necrotic collections: a comparative study
Mateusz Jagielski, J. Piątkowski, M. Jackowski
Collegium Medicum, Nicolaus Copernicus University, Department of General, Gastroenterological and Oncological Surgery, Poland
Aims: Transmural endoscopic drainage is commonly used in the treatment of walled-off pancreatic necrosis in the late phase of acute necrotizing pancreatitis. This study aimed to prospectively evaluate and compare early endoscopic treatment in acute necrotic collections and that in walled-off pancreatic necrosis.
Methods: Overall, 184 patients hospitalized for acute pancreatitis and its complications including pancreatic and peripancreatic fluid collections were screened. Overall, 71 patients with acute necrotizing pancreatitis who underwent transmural endoscopic drainage for pancreatic necrotic collections were included. The procedure was performed within 4 weeks of acute necrotizing pancreatitis in 25 (35.21%) patients (Group 1- acute necrotic collection) and beyond 4 weeks after formation of walled-off necrosis in 46 (64.79%) patients (Group 2- walled-off pancreatic necrosis).
Results: The overall mean (range) age of patients was 49.9 (22–79) years and 59 of them were males. The mean time to active drainage and duration of total treatment was 26.8 and 16.9 days (P = 0.0001) and 270.8 and 164.2 days (P = 0.0001) in Groups 1 and 2, respectively. The average total number of endoscopic interventions was 9.5 and 4.5 in Groups 1 and 2, respectively (P = 0.0001). The clinical success rate, frequency of complications of endoscopic interventions, long-term success rate, and recurrence rate were not significantly different between the groups (P > 0.05 for each).
Conclusions: Endoscopic treatment is effective and safe in managing early necrotic collections within the first 4 weeks of acute pancreatitis. However, compared with endoscopic intervention in walled-off pancreatic necrosis, more interventions and longer duration of drainage are required.
Hernia-adhesions—abdominal wall hernia
P153—Preliminary results of minimally invasive approach on incisional/ventral hernia repairment in a recent created hernia unit
Katherine Teresa Plua-Muñiz, F.J. Tejro-Pintor, M. Toledano-Trincado, R Otero-Roussel, A. Centeno-Velasco, J.I. Blanco-Alvarez, J.M. García-Abril Alonso, C. Tinoco-Carrasco, C. Cuesta De La Llave, L.M. Diez-González, D. Pacheco-Sánchez
Hospital Universitario Rio Hortega, General and Digestive Surgery, Spain
Objective: The aim of this study was to compare the laparoscopic and laparotomic approach on abdominal incisional/ventral hernia treatment.
Patients and methods: A prospective study was performed including 38 patients having incisional or ventral hernias who underwent laparoscopic and laparotomic approach in our institution between January-June 2020.
Results: Thirty-eighth repairs were performed in 18 women and 20 men with a mean age of 61.45 ± 14.73. Mean body mass index was 29.7 ± 5.11 kg/m2. Laparoscopic procedure was performed in 11 patients and laparotomic approach in 27 patients. The abdominal wall defect size was 5.99 cm ± 3.44, slightly bigger for laparotomic approach (6,11 vs 5,7 cm). The mean operative time was 211.81 ± 39.64 min for laparoscopic approach vs 146.29 ± 111.96 min for laparotomic approach (p = 0,012). Patients undergoing laparoscopic repairment were less likely to have the closure of anterior fascia during the surgery (54.5% vs 92.3%, p = 0.10). Immediate postoperative complications rate was 36.8%, laparoscopic approach: 9.1% vs laparotomic approach: 48.1% (p = 0.015). The laparotomic approach had higher rates of seroma, hematoma, and wound infection.
Conclusion: Laparoscopic approach in abdominal hernia repair is rising. Its advantages have been recognized worldwide. In our short experience, the minimally invasive approach has better short-term outcomes in morbidity than the laparotomic approach. More cases are needed to definitive conclusions.
Hernia-adhesions—abdominal wall hernia
P154—Laparoscopic single incision Rives-Stoppa repair (SILS-RS) for Ventral hernia
Feasible procedure for institution without Robot assistance
Takeshi Nagahama
Kudanzaka Hospital, General Surgery, Japan
Aims: eTEP Rives-Stoppa repair is established method for the repair of ventral hernia. However, there are some technically difficult procedures like midline crossover. We have introduced this SILS technique into Rives-Stoppa repair (SILS R-S repair) to solve problems mentioned above.
Method: From 2016/11 thirty-three patients of midline incisional hernia, primary ventral hernia underwent SILS R-S method.
For this method, small midline incision 5-6 cm away from hernia orifice was carried out. This procedure can be done either bottom-up or top-down and decided by the location of hernia orifice. Initially dissection of bilateral anterior rectus sheath and linea alba was dissected under direct vision to obtain spaces to apply SILS device. After creating space for SILS device laparoscopic dissection of bilateral retro-rectus space was done. For bottom-up fashion lateral dissection up to preperitoneal space was carried out to demonstrate arcuate line. Bottom-up TAR was initiated from dissection behind arcuate line. Further dissection of linea alba, retro-rectus space, and hernia orifice was also carried out by SILS. Defect closure of anterior and posterior rectus sheath using barbed suture was also done by SILS and self-grip mesh was inserted.
Result: For thirty-three patients SILS R-S method was carried out successfully. Duration of surgery was ranged from 93-260 min and width of hernia was 20–90 mm. Sixteen patients received TAR (Unilateral 3, Bilateral 13). In the perioperative period we have no experience of adverse event. During follow up ranged 1 to 47 months, we have experienced no case of recurrence.
Discussion: eTEP Rives-Stoppa repair was one of the most effective procedures for midline incisional hernia repair. However, there are couple of procedures which can be an obstacle such as midline cross-over where robot assistance was unavailable. Using SILS TEP technique, linea-alba can be observed in front and do not need midline cross over. Handling of needle holder from midline was ergonomic for midline defect closure. TAR procedure was also possible from midline incision by SILS. SILS TEP device and midline incision contributed to easier preparation of whole retro-rectus spaces and defect closure.
Conclusion: SILS R-S method can assist introducing of eTEP Rives-Stoppa procedure easier.
Hernia-adhesions—abdominal wall hernia
P155—The incidence of complications with using Veress needle in palmar point and strategies to avoid complications
Vamshi Krishna Vennamaneni
SRM Medical College and Hospital, Urology, India
Introduction: As advances in laparoscopic skills and instrumentation evolve, increasingly complex procedures are being performed, yet most complications are associated with primary access. Gaining access into the abdomen has been the challenging issue in terms of complications. Risk increases in cases with previous surgery.
Post surgical adhesions occur in 70–95% of patients undergoing major GI surgery. The overall incidence of major injuries at the time of entry is 1.1/1000. Bowel injuries have occurred in 0.7/1000 laparoscopies and major vascular injuries in 0.4/1000 laparoscopies. Despite considerable advances in endoscopic techniques and instrumentation, inadvertent and potentially avoidable entry injuries continue to occur.
Aim: Veress needle continues to be used in vast majority of smaller centers for creating pneumoperitoneum in ventral, umbilical hernia and in cases where there was a previous surgery and high chance of adhesions.
Retrospective data from case records and video reviews were used to critically analyze how the complications occurred and formulate guidelines to prevent them.
Methods: A total of 50 cases listed for diagnostic or operative laparotomy with a history of previous abdominal surgeries, where palmar point was used for veress needle insertion were studied.
All cases were done between January 2017 to December 2018, the clinical data was filled in data sheets and results were analyzed.
Exclusion criteria:
Splenomegaly.
Hepatomegaly.
Previous left upper quadrant surgery.
Conclusions: People with high BMI(> 28) has increased risk of organ injury with veress needle.
Large sagging abdomen changes landmarks.
In obese patients the point of initial entry was reassessed after surgery, the point was lateral to palmar point.
So there was minimal space and more risk of injury.
Good relaxation is an absolute prerequisite.
We strongly advise marking all the landmarks.
All the tests like aspiration, drop suction and intra-peritoneal pressure readings should be done with each attempt.
When more than 2 attempts are taken, if uncertainty exists alternative approach to create pneumoperitoneum should be chosen for safety.
Discussion: The success or failure of most laparoscopic surgeries is determined in the initial minutes during placement of the operative ports. This is especially true in obese patients.
Obesity increases the distance between skin and fascia and can increase the distance between fascia and peritoneum. The difficulty of placing the Veress needle or trocar into the peritoneal cavity increases with this distance.
Dissection to the level of the fascia for an open (Hasson) approach sometimes requires incision extension and increases the risk of postoperative wound infection.
Obesity also changes the relationship of the umbilicus to the aortic bifurcation; umbilicus migrates caudally in relation to the aortic bifurcation as the BMI increases.
In non obese patients (BMI < 25), the umbilicus had a median location 0.4 cm caudal to the bifurcation.
In overweight (BMI 25 to 30) and obese (BMI > 30) patients, the umbilicus had a median location 2.4 and 2.9 cm caudal to the aortic bifurcation, respectively.
The distance between the umbilicus and peritoneum at a 45° angle from the umbilicus into the pelvis, in both non obese and overweight patients, was only 2 cm.
In obese patients, this distance increased to a median of 12 cm.
The distance between the umbilicus and the underlying vessels was only 6 cm at a 90° angle in non obese patients but averaged 13 cm in obese patients.
To optimize intra-peritoneal Veress needle and trocar placement while minimizing risk to the underlying vasculature, a 45° angle from the umbilicus toward the pelvis in non obese patients and a 90° approach in obese patients. In overweight patients, the approach should range between 45° and 90°.
References: 1.Nutan Jain, Vandana Jain, Chetna Agarwal, Priyanka Bansal, Sunil Gupta, Bhumika Bansal, left lateral port: safe laparoscopic port entry in previous large upper abdomen laparotomy scar, journal of minimally invasive gynecology, volume 26, issue 5, 2019,
2. Hurd WW, et al. The relationship of the umbilicus to the aortic bifurcation: implications for laparoscopic technique. Obstet Gynecol. 1992;80:48–51.

Hernia-adhesions—adhesions
P156—Laparoscopic management of mesh infection following laparoscopic inguinal hernia repair: Case report and short literature review
Andrei Marginean1, T. Talpai2, B. P. Uricanu2, M. M. Margan2, C. Gheorghe1, A. Tomescu3
1Military Hospital Timisoara, General Surgery, 2University of Medicine and Pharmacy "Victor Babes" Timisoara, 3Genesys Medlife Arad, General Surgery, Romania
Aims: Mesh infection following laparoscopic inguinal hernia repair is considered a rare complication due to the low risk of contamination that is associated with minimally invasive surgery (MIS). Guidelines for such cases are not available and complications caused by surgical treatment may increase morbidity. The objective of this clinical case report is to highlight the effective method for treating such patients via relaparoscopy with a brief literature report.
Methods: We present the case of a 53-year-old female that came to our clinic complaining of persistent pain and a chronic secreting fistula in her left lower quadrant. The patient had undergone one year earlier MIS for a left-sided inguinal hernia that was repaired through a transabdominal pre-peritoneal approach, which became infected after the following 2 months. Conservative treatment through percutaneous drainage was attempted multiple times, but with no definitive results. Based on the clinical presentation and CT scan, and the diagnosis of an infected mesh was made. Treatment consisted of laparoscopic exploration of the entire pelvic area, drainage of the abscess, followed by the excision of the entire mesh. Complications may include vascular and nerve injury or hollow organ perforation.
Results: Following surgery, the patient underwent total recovery, with no recurrence of the inguinal hernia, following one year since her initial presentation, probably due to the fibrous remodeling of the abdominal wall caused by the local inflammatory response.
Conclusion: We conclude that laparoscopic meshectomy can be considered a viable option over an open approach for patients presenting with an infected mesh that was previously placed through similar MIS procedures.

Hernia-adhesions—adhesions
P157—Inflammatory Reaction to ALD Coated Polypropylene Meshes used for Hernia Repair. An Experimental Study in Animals
I. Abdulagatov, A Maksumova
Dagestan State Medical University, Nanomedical Technology, Russia
In this work, temperature-controlled atomic layer deposition (ALD) was used for the first time to synthesize vanadium-doped TiO2 thin film on polypropylene (PP) hernia meshes. Multiple layers of (Al2O3 + TiO2/V2O5) nano-films were coated on the PP hernia mesh surface to provide a layer with a thickness of 38 nm using ALD technique (10 nm of Al2O3 and 28 nm of TiO2 doped with V2O5) to improve its antibacterial properties, thereby, prevent mesh-associated post-surgery complications. The present work shows that ALD can produce a uniform coating of the vanadium-doped TiO2 nano-film throughout the PP mesh at a temperature of 85 °C, and the nano-film thickness can be controlled by the number of ALD cycles. Rats and rabbits have been used to evaluate the tissue reaction of coated PP hernia meshes and for biomechanical testing of the healed tissue. We have a 5 rabbits and 10 rats experiments where have been implanted multiple layers of (Al2O3 + TiO2/V2O5) –coated and uncoated (control) PP meshes into the abdominal wall. Histology of the mesh-adjacent tissues and electron microscopy of the explanted mesh surface were performed to characterize host tissue response to the implanted PP meshes. The effect of vanadium-doped TiO2 coating on a living organism and fibroblast functions and bacterial activities were studied. The present results indicated that vanadium-doped TiO2 stimulated osteoblast adhesion, barrier and antibacterial activity compared to uncoated PP mesh. It was shown that vanadium-doped TiO2 coatings were highly effective in inhibiting S. aureus adhesion and exhibited excellent biological activity in promoting osteoplastic adhesion. The animal test showed that ALD coated (Al2O3 + TiO2/V2O5) nano-film on PP mesh can be used to prevent post-surgery complications. We have reported comparative analysis of the use of pure TiO2 (vanadium-free TiO2 coatings) and vanadium-doped TiO2 as a coating for PP meshes and their action on biological environment and preventing biofilms formation. The present study showed that effective prevention of mesh-associated post-surgery complication (biofilm formation) may be achieved by functional surface coatings (application of coating of (Al2O3 + TiO2/V2O5) to the PP mesh) that provide non-adhesive and functional (antibacterial) properties. PP meshes coated with vanadium-doped TiO2 coating are improving of the biocompatibility, barrier, and significantly lower shrinkage rates compared with an identical PP mesh without a coating.
Hernia-adhesions—emergency surgery
P158—Management Of Pericaecal Hernia Causing Small Bowel Obstruction In The Evolving Era Of Laparoscopy. A Case Report And Literature Review
Mohamed Salama1, Ahmed Salama2, F. Kazi1, B. Sami1, A. Nasr1
1Our Lady of Lourdes Hospital, General Surgery, 2Trinity College Dublin, School of Medicine, Ireland
Introduction: Although the diagnosis of intestinal obstruction is straightforward, its aetiology is often difficult to determine preoperatively despite the availability of modern imaging techniques. Internal hernias are an unusual cause of intestinal obstruction first described by Steinke in 1932. Pericaecal hernias are an exceptionally rare type of internal hernia.
Laparoscopy for small bowel obstruction was previously considered inappropriate. We present a case of Pericaecal hernia causing small bowel obstruction treated successfully with a laparoscopic approach.
Case report: 64 year old man presented with abdominal pain, vomiting and constipation for 3 days, no previous surgery. Small bowel obstruction confirmed on PFA and CT scan. He was treated conservatively for 10 days without settling. He had an exploratory laparoscopy which revealed a Pericaecal hernia. This was reduced with gentle manoeuvre and the peritoneal folds were divided to prevent recurrence. He made good recovery and was discharged the next day post-surgery.
Discussion: Internal hernias have an overall incidence of < 1% but they constitute of up to 5.8% of all small bowel obstruction. Perioperative diagnosis of internal hernia is extremely difficult because of nonspecific presentation. Pericaecal hernia is an uncommon type of internal hernia. CT is a gold standard imaging modality however CT diagnosis of internal hernia remains difficult (review of cases shows that internal hernias were diagnosed at exploratory laparotomy performed for intestinal obstruction). Laparoscopy is a valuable tool for both diagnosis and treatment with the advantage of minimal invasive procedures. However, the laparoscopic manipulation of distended bowel loops remain controversial because of high risk of perforation, reduced space to work in the peritoneal cavity and requirement of advanced laparoscopic skills. Laparoscopic treatment of Pericaecal hernia was reported about 17 years ago but has since been reported more frequently and in recent years there is a move towards laparoscopic diagnosis and management of Pericaecal hernias.
Conclusion: Although a CT scan is a valuable tool, the CT diagnosis of internal hernia remains difficult.
With the advent of minimal access surgery, diagnostic laparoscopy may be a safe and feasible modality to diagnose and deliver definitive treatment of small bowel obstruction secondary to Pericaecal hernia.
Hernia-adhesions—emergency surgery
P159—Exploratory laparoscopy in adult idiopathic intussusception
Paula Perez, M. Alonso Grela, R. Fernandez Santiago, G. Gutierrez Fernandez, A. Lozano Najera, L. Cristobal Poch, A. Del Castillo Criado, J.C. Rodriguez Sanjuan
Hospital Universitario Marqués de Valdecilla, General Surgery, Spain
Introduction: Intussusception refers to the penetration of a segment of the digestive tract into another located distally, which may cause intestinal obstruction or even strangulation. Its incidence is high in children. However, adult intussusception occurs in only 1–5% of patients suffering from small bowel obstruction and in 90% of cases, an organic lesion is found. The most common locations is ileo-ileal. Other localions are extremely infrequent.
Material and methods: We present the case of a 35-year-old woman who comes to the emergency room of our center presenting symptoms of intestinal obstruction.
As a clinical history to highlight, this patient had a similar event three years earlier, being diagnosed with intussusception that was resolved conservatively. After studying the case by enteroMRI and capsule endoscopy without finding an underlying cause, it was decided to perform programmed exploratory laparoscopy in which no findings of pathological significance were evidenced.
At the present time, our patient came to the emergency room with vomits and constipation of almost a week of evolution. Analytically, there is no alteration of the acute phase reactants. An abdominal CT scan was performed, which showed an image compatible with ileo-ileal intussusception. Given these findings, it was decided to perform urgent diagnostic laparoscopy.
Results: In the surgery, chronic dilation of the entire small intestine was observed, with numerous places of previous invaginations, without observing anything pathological to justify it. No pathological findings in meso, no herniations or flanges.
The evolution of the patient is favorable and she is discharged 48 h after surgery.
Conclusion: An intussuspection is a rare cause of adult intestinal obstruction. It is generally caused by benign lesions such as fibroid polyps. There is insufficient evidence in the literature on cases of idiopathic intussusception in adults. Connective tissue pathologies could be related to this type of process.
Hernia-adhesions—emergency surgery
P160—Laparoscopic interventions for acute appendicitis and acute calculous cholecystitis during pregnancy
Vasyl Mishchenko1, V. Mishchenko2, I. Rudenko3
Odessa National Medical University, Ukraine, 1Departament of Surgery 1, 2Departament of Obstetrics and Gynecology, Ukraine. 3Department of Clinical Sciences (Obstetrics and Gynecology) College of Medicine, Gulf Medical University, United Arab Emirates
Emergency surgical interventions for acute appendicitis, cholecystitis are performed in 1–2% of pregnant women. Achievements of laparoscopic surgery in recent years recommend the method of laparoscopic surgery in pregnant women as a safe, feasible and optimal approach to the treatment of acute abdomen during pregnancy for non-obstetric indications. The location, location and number of ports for the introduction of working tools, the effect of carbon dioxide insufflation pressure on the uteroplacental circulation, the choice of anesthesiological aid requires a balanced approach when performing laparoscopic surgery for acute appendicitis, cholecystitis during pregnancy.
Purpose: To show the possibility of using laparoscopic interventions for acute appendicitis and acute calculous cholecystitis during pregnancy.
Methods: The results of treatment of acute non-obstetric surgical pathology (acute appendicitis, acute calculous cholecystitis) in 6 pregnant women in the second and third trimesters of pregnancy using the laparoscopic method under endotracheal anesthesia using muscle relaxants are presented. Hasson's open technique for introducing a Veresh needle and a 1.0 cm diameter trocar for the optical camera in the umbilic was used for laparoscopic access in all pregnant women. In 4 cases, the four-port method was used, in the remaining 2 cases, three ports were used.
Results: 6 laparoscopic operations were performed according to urgent indications. 4 laparoscopic appendectomies were performed at 12, 20, 24 and 31 weeks of gestation. The histological conclusion is acute phlegmonous appendicitis. 2 laparoscopic cholecystectomies were performed at weeks 14 and 16 for acute calculous cholecystitis. The histological conclusion is acute phlegmonous calculous cholecystitis. There were no signs of peritonitis. The average age of women was 28 years. There were no postoperative complications from the mother, cases of abortion in the postoperative period and fetal death. The average hospital stay was 3 days. The average gestational age at birth was 39.2 weeks. All patients had normal vaginal delivery on time.
Conclusion: Laparoscopic surgical approach is a safe and optimal treatment for acute appendicitis and acute calculous cholecystitis during pregnancy.
Hernia-adhesions—emergency surgery
P162—The neglected surgery—Hernioscopy—Maybe the best choice for strangulated groin hernias in the COVID-19 pandemic
Baris Mantoglu, E Gonullu
Sakarya University Teaching and Research Hospital, General Surgery, Turkey
Aims: Although the Covid -19 pandemic had an effect on delaying elective surgeries worldwide, emergency operations which are not be postponed were performed under unconventional conditions with the suggestions of international guidelines. In general surgery practice, incarcerated / strangulated inguinal hernias have a prominent place among emergency surgeries. In 1% of these patients, the hernia content reduces spontaneously into the abdomen until the hernia sac is opened. It is imperative that these bowel segments be evaluated for possible intestinal necrosis.
Methods: Patients who underwent emergency surgery and hernioscopy in the Sakarya Training and Research Hospital General Surgery Service due to incarcerated or strangled inguinal hernia during the period from March 2020 to October 2020 were included in the study. Hernioscopy procedure was performed using single-port and glove-port methods. For each patient, age, duration of complaints, comorbidities, hernia repair method, operation time, incarcerated organ, whether ischemia improved after reduction or whether resection was required, postoperative complications were recorded.
Results: Hernioscopy was performed on ten patients due to strangled inguinal hernia during the eight months. While femoral hernia was detected in 2 patients, eight patients had an inguinal hernia. In 1 patient, bowel resection and anastomosis were performed with the transabdominal approach because the small intestine necrosis was detected during the hernioscopy procedure.
Conclusion: The hernioscopy method, which is performed under spinal anesthesia, prevents unnecessary laparotomies and should be preferred more during the COVID-19 pandemic process in patients who are urgently operated for strangled inguinal hernia.
Figure 1. Hernioscopy in stranglutated groin hernias 

Hernia-adhesions—emergency surgery
P163—Videolaparoscopy in diagnosis and surgical treatment of combat abdominal trauma
Vitalii Shapovalov1, M. Kashtalyan2, R. Enin3, D. Karadyaur1
Military-medical clinical center of the South region, Odessa, Ukraine, 1Urgent surgery, 2Abdominal surgery, 3Colorectal surgery, Ukraine
Aims: The aim of the study was to improve the results of treatment of the wounded with combat abdominal trauma at the expense of the improved system of diagnosis using pulse oximetry, FAST-protocol and surgical treatment applying endovideosurgical technologies.
Methods: A comparative analysis of the results of treatment of 157 wounded from the area of the anti-terrorist operation in the eastern Ukraine is presented who were hospitalized in the period from 2014 to 2018 at the 2nd-4th levels of medical aid and had isolated and combined combat trauma to the abdomen. Depending on the method of treatment used, the wounded were divided into two groups: the first group (the comparison group) consisted of 81 wounded persons with combat abdominal trauma that were treated in the period of 2014–1015 according to traditional tactics using laparocentesis and laparotomy.The second group (the main group) consisted of 76 wounded who received a comprehensive method of diagnosis, which included pulse oximetry, FAST protocol, laparocentesis, and surgical treatment was performed using endovideosurgery in the period of 2016–2018.
Results: High efficacy of endovideosurgery applied in the treatment of the wounded of the main group was determined in 30 mildly wounded (39.4%) with the perfusion index of 4 and in moderate severity—27 (35.5%), the perfusion index of < 4. Significant diagnostic and therapeutic value of endovideosurgery was determined in the treatment of the closed combat abdominal trauma in 12 (15.7%) wounded, and non-penetrating abdominal injuries in 27 (35.5%) wounded of the main group. The developed method of dynamic endovideosurgery according to the tactics of the "second look" using 5 or 10 mm allowed detecting early postoperative complications in 11.8% of the wounded within a short time and performing timely medical correction without increasing surgical trauma, and making sure of absence of complications in 15.7% of the wounded.
Conclusion: Based on the results of the study, we have shown the advantages of applying advanced comprehensive diagnostic measures using pulse oximetry and FAST protocol and surgical treatment performing endovideosurgery in the treatment of the wounded of the main group.
Hernia-adhesions—emergency surgery
P164—Evaluation of The effectiveness of laparoscopic approach in emergency abdominal surgery: three-year experience in University Hospital
Ahmed Elnabil-Mortada, A. Amir Eskandar, H. Elmaleh, R. Abdellatif
Ain Shams University Hospitals, General Surgery, Egypt
Background: Peritonitis is a common cause of surgical emergency and a challenge to the surgeon to achieve correct diagnosis to avoid unnecessary laparotomies and its related morbidities. Recently laparoscopy had become the ideal minimally invasive technique that allows proper diagnosis and appropriate treatment of patients with various causes of generalized peritonitis. Our study aimed to compare the efficacy of laparoscopy and conventional open laparotomy in the surgical management of patients with peritonitis.
Patients and Methods: prospective cohort study, Between Jan 2016and Jan 2018, 100 patients were enrolled in a prospective comparative study comparing open and laparoscopic surgical management of peritonitis, excluding trauma patients at Ain Shams University hospitals. Each group include 50 patients, with mean follow up of 3 month. Laparoscopic Management (LM), and Open Management (OM). Preoperative, Operative, post-operative data and outcomes measures were collected and statistically analysed.
Results: There were 5 cases (10%) of conversion to open surgery in the laparoscopy group. A statistically significant difference in favour of the laparoscopic management group was seen regarding the reduction in postoperative pain, early oral intake, shorter hospital stay, lower early and late wound complications rate. On the other hand, the mean operative time was longer in the laparoscopy group with statistically significant difference.
Conclusion: Laparoscopic management of peritonitis is safe and feasible, overall significant shorter recovery time with significant reduction in incisional hernia rate outweigh the longer operative time.
Keywords Laparoscopic surgery, Minimally invasive surgery, Peritonitis, Perforated peptic ulcer, Complicated appendicitis, Diverticulitis, Mesenteric vascular occlusion.
Hernia-adhesions—emergency surgery
P165—Surgical Consultation For Nonsurgical Inpatients In Our Institution: Can It Be Improved?
Mohamed Salama1, Ahmed Salama2, W. Shabo1, A. Kazi3, A.Nasr1, S. El Masry1
1Our Lady of Lourdes Hospital, General Surgery, Drogehda, 2National University of Ireland Galway (NUIG), 3St Vincents University Hospital, Dublin, Ireland
Introduction: Consultation is common in our daily practice. It is a corner of modern inpatient care. When inpatients require additional clinical expertise or procedures, other teams may become temporarily involved through consultation, involving substantial inter-clinical communication of patient specific information critical to care continuity and patient safety. Little information exists in the literature to guide consult interaction between different medical specialities and there is a lack of evidence based data on the evolution of consulting practices.
Aims: To explore and evaluate the nature and outcomes of inpatient surgical consults by other teams in our hospital.
Methods: Data were prospectively collected on all patients referred to surgical services over a period of 3 months (1st Jan-31st Mar’20).
Data collected: Source of referral (Orthopaedic, Medical, Gynaecology, Paediatrics), Consultation reason, Investigations and physical examination findings, Required investigations after consultation and outcome of consultation.
Patients excluded: Consultation in A&E department, theatre, OPD, endoscopy and Consultation from MDM (GI or Oncology meeting).
Results: Total number: 150 (male: 82, female: 68, age range: 3–96). Sources of consultation: Medical = 121, Orthopaedic = 14, Paeds = 8, Gynae = 7. Inappropriate consultation: 9 (7 late consultations, 2 missed issues). No electronic or official consultation form was requested.
Consultation reasons: Abdominal pain/distension/N and V: 79, Lower GI bleeding: 15, Upper GI bleeding: 10, Cellulitis/abscess/ulcer and haematomas: 25, Abnormal investigation: 4, Chest drain and complication: 4, Haematuria and retention: 4, Difficult catheterization: 2, Pressure sore: 2, Ischaemic leg and bleeding V.V: 2, TMJ dislocation: 1
Further investigations requested: CT: 51, US: 20, X-ray: 3, MRCP: 2, Bloods in most cases.
Procedures performed after consultation: Reduction of TMJ dislocation: 1, OGD: 20, Colonoscopy: 6, Sigmoidoscopy and rectal tube insertion: 5, Laparotomy: 5, Debridement: 4, Urinary catheterization: 3, faecal disimpaction: 2, Appendectomy: 2, ileostomy: 1, Incision and drainage: 3, IR Drainage: 4.
Conclusion: Inpatient surgical consultations generate a significant workload. Currently it is mandatory that patient management is carried out in a multidisciplinary approach; however we believe that consultation should be requested in a more selective manner. Consultation must be given proper attention and should be a part of medical education.
Hernia-adhesions—emergency surgery
P166—Evaluation of Seasonal Appendicitis In a single Irish Institution
Mohamed Salama1, A. Gervescu1, A. Salama2, F. Kazi1, I Ahmed1
1Our Lady of Lourdes Hospital, General Surgery, Drogheda, 2NUI Galway, Ireland
Introduction: Acute appendicitis is a common clinical condition worldwide. Its incidence varies between countries, and a few studies reported seasonal variations of acute appendicitis, however with variable results and conflicting data. There is no data to our knowledge available regarding seasonal variation of acute appendicitis in the Republic of Ireland. Aim To evaluate the seasonal variation of acute appendicitis in our institution.
Method: This is a retrospective cohort study, of all patients who underwent open or laparoscopic appendicectomy for acute appendicitis, over a period of 5 years, between 2012 and 2016. Interval appendicectomies and appendicectomies as part of any other surgical intervention were excluded. We included a total of n = 2341 appendicectomies (52% male, 48% female), of which 1848 were histologically confirmed (940 male, 878 female), and also divided them into 3 categories (oedematous, suppurative and gangrenous). We have also analyzed the seasonal variations based on the presence of parasitic organisms (Enterobius Vermicularis-pin worm) and also the presence of perforation in the histological specimen.
Results: The difference in appendicitis seasonal incidence is not statistically significant with X2(3, N = 2341) = 4.42, p = 0.220 (> 0.05). The appendicitis incidence not being dependent on season for either male X2(3, N = 1137) = 1.62, p = 0.654 (> 0.05) or female patients X2(3, N = 1204) = 3.43, p = 0.343 (> 0.05) There is no significant statistical connection between the type of appendicitis and the season with X2(6, N = 1706) = 12.31, p = 0.055 (> 0.05). Having a p value so close to 0.05 (p = 0.055) it is important to note that the 2 variables associate strongly but this link is not statistically significant. The seasonal variations based on the presence of parasitic organisms is not statistically significant X2(3, N = 1699) = 6.52, p = 0.089 (> 0.05) The incidence of perforated appendicitis is not significantly associate with the season X2(3, N = 1706) = 5.89, p = 0.117 (> 0.05)
Conclusion: There is no significant seasonal incidence variability in regards to acute appendicitis in our institution over a period of 5 years, however further studies on a more controlled cohort of patients are necessary to address the hypothesis.
Hernia-adhesions—emergency surgery
P167—Acute Appendicitis In The Elderly: A single Irish Centre Experience In The 21st Century
Mohamed Salama1, A. Salama2, B. Sami1, A. Nasr1
1Our Lady of Lourdes Hospital, General Surgery, Drogheda, 2National University of Ireland Galway (NUIG), Ireland
Introduction: Acute appendicitis is a common clinical condition worldwide. Its incidence in the elderly has increased and continues to be a challenging surgical problem due to late and atypical presentation. Aims To present our experience and outcomes of acute appendicitis in elderly patients. Methods During a period of 5 years (January 2012 to December 2016), 54 cases above age of 60, with definite pathological diagnosis of acute appendicitis, were retrospectively analysed. We comply in our hospital with the NCEPOD guidelines.
Results: Out of 54 patients (31 male and 23 female), non-perforated appendicitis NP (n 41), perforated appendicitis P (n = 13) were histologically confirmed. Perforation rate was 24%. Mean age was 67. Mean duration onset of symptoms was 2 days in NP group and 3 days in P group. All patients had an increase in inflammatory markers (WCC and CRP), with the P group having a higher reported CRP overall (SD = 114 in P group to SD = 90.1 in the NP group). CT was performed on all patients. Mean waiting time to access the CT with final report was 15.4 h (SD = 6.7) in NP group and 15.2 h (SD = 6.5) in P group. All cases underwent laparoscopic appendicectomy (49/54 were operated on within 12 h from CT report, 3/54 between 12 and 24 h and 2/54 after 24 h). CT reported perforated appendicitis for 7/41 cases from NP group and 4/13 cases from P group. 1 reported appendicular abscess and 1 mucocele in the NP group. Mean length of hospital stay was 7.6 days (SD = 6.4) in NP group versus 7.2 days (SD = 4.3) in the P group versus 3.2 days (patients younger than 60 years). No major morbidity or mortality was recorded in this study.
Conclusions: Acute appendicitis in the elderly remains a challenge for practicing surgeons. CT scan is an essential aid for early diagnosis and management. Laparoscopic appendicectomy is a successful and standardised approach in treating acute appendicitis in patients older than 60 years. CT scan and laparoscopy reduce morbidity and mortality, especially in the elderly population, because of early diagnosis and prompt surgical treatment.
Hernia-adhesions—emergency surgery
P332—PVDF Dual Mesh Reinforcement of Laparoscopic Primary Repair of an Acutely Incarcerated Traumatic Diaphragmatic Hernia
Alexandros Chamzin, Charalampos Theodoropoulos, Ch. Theodoropoulos, G. Ayiomamitis, A. Larentzakis, A. Triantafyllou, T. Triantafyllou, D. Theodorou, G. Zografos, K. Toutouzas
Hippocration General Hospital Athens, 1st Propaedeutic Surgical Department, Greece
Aim: To present the laparoscopic repair of an acutely incarcerated traumatic diaphragmatic hernia using a cyanoacrylate glue fixated PVDF dual mesh.
Case Presentation: A 41 year-old man presented to the emergency department with a 2-day history of diffuse abdominal pain. The patient reported a left thoracoabdominal stab wound 1 year ago. A CT scan was performed and a left hemidiaphragmatic defect was present through which the left colic flexure ascended to the left hemithorax. A laparoscopy was undertaken with reduction of hernia contents, primary suture repair of the diaphragmatic defect and suture line augmentation with a 12 cm round, microporous PVDF dual mesh, anchored with cyanoacrylate glue. The patient had an uneventful postoperative period and was discharged on POD 4.
Discussion: Traumatic diaphragmatic injuries accompany approximately 1% of patients with thoracoabdominal trauma, most commonly following penetrating chest injuries. Clinical presentation varies from an acute disruption of diaphragmatic continuity to the insidious development of a chronic diaphragmatic hernia. In cases of symptomatic traumatic diaphragmatic hernias, emergent repair is advised with airtight closure of the diaphragmatic defect.
Conclusions: Laparoscopic approach in the emergent repair of an acutely complicated diaphragmatic hernia is feasible and safe. Mesh reinforcement is advised, preferably anchored without using penetrating techniques.
Hernia-adhesions—emergency surgery
P337—Strangled inguinal hernia in a woman by laparoscopy
Soufiane Zatir
Militery Hospital of Oran, Medicosurgical Emergency Department, Algeria
The laparoscopic approach for the repair of inguinal hernias has been well documented in the literature and widely accepted throughout surgical practice. However, the use of this approach for the management of incarcerated or strangled hernias has been a controversial issue, with some surgeons being cautious in using this technique, This can be attributed to the technical difficulties encountered in reducing the hernial sac. and its content and increased risk of iatrogenic lesions.the patient admitted to the operating room in dorsal decubitus, endotracheal intubation under general anesthesia. placement of the trocars intra-abdominal Fig. (2), insufflation of the pneumoperitoneum.—exploration of the abdominal cavity found an inguinal hernia incarcerated in the right inguinal orifice made of a suffering omentum and no associated digestive structure. Also, the contralateral exploration does not find a contralateral hernia or associated crural hernia. We initiate our reduction of the hernia by being careful not to pull too much on the omentum so as not to damage the contents of the sac, resection of the necrotic part of the omentum and reduction of the hernial sac. Ouverture du péritoine pariétale en faisant attention de ne pas blessé les vaisseaux épigastriques, et libération de l’espace de retzus jusqu'au ligament de Cooper, dissection latérale vers le muscle de psoas pour agrandir l’espace prèpèritonale a fin de mettre en place la prothèse 3 D en toute sécurité. En fin d’intervention fermeture du péritoine pariétale, exsufflation des gaz et fermeture des orifices des trocarts sans drainage.la patiente a eu une bonne évolution postopératoire, une reprise du transit rapide et un lever précoce au premier jour postopératoire,elle a été mis sortante au deuxième jour après l’intervention.Conclusion:
Nous pouvons conclure que l’approche miniinvasif laparoscopie en particulier la TAPP dans le traitement des hernies inguinales étranglées ou incarcérées, est faisable en toute sécurité avec une expertise nécessaire. Ainsi, cet abord nous donne plusieurs avantages, a savoir de traiter l’étranglement et la hernie dans le même temps opératoire, un retour rapide a l’active quotidienne, absence de sepis pariétal et un cour séjour hospitalier. Cependant D'autres essais contrôlés randomisés sont nécessaires pour confirmer la supériorité de l'approche laparoscopique sur l'approche ouverte dans la gestion des hernies étranglées ou engouées.
Hernia-adhesions—inguinal hernia
P168—Tapp repair of inguinal hernia in patients with decompensated cirrhosis and ascites
Sergiu Pisarenco, G Anghelici, T Zugrav
State University of Medicine and Pharmacy "Nicolae Testemitanu", Surgery Department N2, Surgery clinic "Constantin Tibirna", Moldova
Aims: Evaluation of the possibilities, advantages and safety of laparoscopic treatment of inguinal hernias in patients with hepatic cirrhosis and ascites, particulary to evaluate the TAPP approach for the treatment of inguinal hernias in patients with hepatic cirrhosis and ascites.
Methods: Group I—TAPP repair in 11 patients with liver cirrhosis and ascites. Group II—Lichtenstein-type hernioplasty in 15 patients with liver cirrhosis and ascites. All pacients underwent planned surgery, after dosage preoperative laparocentesis and correction of liver function indices.
Results: No complications developed in the first group of patients. No site of infection, no edema, no leakage of ascites fluid was observed. Postoperatively, all patients recover well, they noticed less pain, the average VAS pain in the first postoperative day was 4, of which the dose of analgesics was much lower. Patients were discharged at home 3–5 days postoperatively. In group II—minor complications were observed: 1 local hematoma, 1 seroma. More expressed postoperative pain syndrome. Duration of hospitalization 6–7 days. During a 10-month follow-up, no patients had recurrence and chronic pain.
Conclusions: TAPP repair performed in pacients with cirrhosis and ascites is safe and feasible. The TAPP repair offered the possibility to appreciate the macroscopic changes of the liver and possibly taking liver biopsies if necessary. TAPP repair reduces the days of hospitalization and postoperative recovery through decrease in pain syndrome. However TAPP repair in pacients with cirrhosis and ascites need to be studied more.
Hernia-adhesions—inguinal hernia
P169—Endoscopic totally extraperitoneal direct groin hernia repair using the endoloop technique
Miroslav Gavrilov, V.S. Kyosev, P.G. Ivanov, V.M. Mutafchijski, G.K. Kotashev, K.S. Vasilev, G.B. Grigorov, D.K. Penchev
Millitary Medical Academy, Endoscopic surgery, Bulgaria
Keywords: Direct groin hernia – TEP technique – Endoloop closure.
Introduction: Endoscopic totally extraperitoneal (TEP) inguinal hernia repair are minimally invasive procedure with significant advantages over open repair. This technique allow simultaneous assessment of the femoral canal and obturator foramen, as well as insertion of a large mesh thus offering a generous coverage of the Hesselbach’s triangle. TEP with PDS Endoloop™ plication of the weakened transversalis fascia is efficient in post-operative seroma prevention, after direct inguinal hernia repair.
Aim: To evaluated long-term tolerability of this new technique in regards to chronic pain and hernia recurrence in patients with direct groin hernia.
Material and methods: Prospective study of consecutive patients treated with PDS Endoloop™ for M2 or M3 direct groin defects, during endoscopic totally extraperitoneal approach between April 2016 and November 2018 year in surgical unit. Meshes were fixed with 2 or 4 tacks. All patients had a minimum 1.2 years (median 2.8 years) follow-up. First outcome was chronic groin/testicular pain; secondary outcome parameters included hernia recurrence and Quality of Life (QoL). Patients were assessed by phone interview.
Results: 36 patients (median age 48 years), 23 of them (64%) M2 and 13 (36%) M3 with direct hernia defects were included in the study. One patient from M3-group had an early recurrence requiring an open repair and was therefore excluded. Eight patients (22%) were lost to long-term follow-up. According to their Carolinas Comfort Scale (CCS range), 24 patients (88%) were very satisfied with their results, 2 (8%) were satisfied, and only one patient (4%) who reported chronic groin pain was unsatisfied. There was no reported long-term hernia recurrence.
Discussion: The EHS guidelines suggest endoscopic TEP repair be the standard treatment in adult patients with primary unilateral inguinal hernia. Chronic groin pain after TEP repair is considerably lower (6%) and incidence of seroma formation has been found to be (0.5–12.2%). Our data have now confirmed that TEP with PDS Endoloop™ plication of the weakened transversalis fascia does not generate any additional symptoms for the patient and thus validates its unrestricted usage for M2 or M3 direct defects. This technique has been adopted by the International Endohernia Society updated guidelines as a valid alternative to the fixation of the extended transversalis fascia to Copper’s ligament, in large direct defects.
Conclusions: The PDS Endoloop™ technique for closure of direct inguinal hernia defects is well tolerated with low risk of seromas, hernia recurrence, chronic pain, and excellent QoL.
Hernia-adhesions—inguinal hernia
P170—Laparoscopic TAPP inguinal hernia repair with 3 × 5 mm port technique: patient reported outcomes
Naveed Hossain, R. Katmeh, L. Soares
Royal Free London NHS Foundation Trust—Barnet Hospital, General Surgery, United Kingdom
Introduction and aims: A three- 5 mm port technique was developed for TAPP inguinal hernia repair with the aims of reducing, among other outcomes, port site hernia and wound infection. Postoperative outcomes were audited at our institution.
Methods: A questionnaire was developed based on the following domains:
- Post procedural pain.
o Postoperative- (2 weeks).
o Acute (2 weeks—6 months).
o Early chronic (6–12 months).
o Late chronic (> 1 year).
- Paraesthesia.
- Time to return to daily activities.
- Time to return to work.
- Return to hospital.
- Recurrence of inguinal hernia.
- Port site hernia.
- Wound infection.
- Satisfaction.
Telephone follow up was carried out using the questionnaire.
Results: 175 patients underwent TAPP inguinal hernia repair between February 2015 and October 2019. 58 out of 89 patients responded (65%), who underwent surgery between July 2017 and October 2019. Of these, 24 underwent bilateral repair (41%), representing a total of 82 TAPP hernia repairs.
Mean age was 67 ± 14 years and 56 (96%) were male.
Postoperative, acute, early chronic and late chronic pain was reported in 61%, 20%, 4% and 1% of patients respectively. There was no statistically significant difference in postoperative pain when comparing age, ASA score or gender. Paraesthesia was reported in 4% of patients < 6 months and 1% > 6 months postoperatively.
47% of patients returned to normal daily activities within 2 weeks, rising to 93.2% of patients at 2 months. Interestingly, this period of disability was significantly shorter for unilateral hernias, with a far greater proportion experiencing a period of disability of less than 2 weeks; while for bilateral hernias a greater proportion experienced a period of disability of between 2 weeks and 2 months (p = 0.021) (Fig. 1). Of those in employment, 90.3% returned to work within 4 weeks.
Mean satisfaction score ± SD (out of 10) was 9.01 ± 1.54. Overall, 98% said they were satisfied with their operation.
3 patients (5.1%) returned to hospital for reasons of constipation, urinary retention and seroma. Five hernia recurrences were reported (6.1%) and no port site hernias were reported. Wound infection was reported by 3 patients (5.1%), of which 2 required antibiotics.
Discussion: Satisfaction rates within our cohort were very positive. Although over half of patients experienced pain or discomfort in the first 2 weeks many of them noted it to be minor and the majority found it had resolved after 2 weeks. No port site hernias occurred amongst our patients with few postoperative wound infections seen, all of which were successfully managed with antibiotic therapy.
Overall, we find that using a three 5 mm port technique in TAPP hernia repair is a viable option giving good functional results while maintaining a low rate of postoperative complications.
Hernia-adhesions—inguinal hernia
P171—"Painless" One day laparoscopic total preperitoneal repair of bilateral inguinal hernia
Aleksandar Gluhovic, UM Milosevic
Clinical Centre of Vojvodina, Clinic for abdominal and endocrine surgery, Serbia
Aim: The aim of this presentation is to show patients satisfaction with laparoscopic preperitoneal repair of bilateral inguinal hernias (TEP) performed as one day surgery, with combination of total endotracheal anesthesia and local lidocaine-bupivacaine infiltration of port sites and preperitoneal space.
Method: During the period 2016–2020 we performed 115 total extraperitoneal laparoscopic operations on patients with bilateral inguinal hernias. All of them were males, aged from 23 to 84 years with no serious comorbidities. Patients are admitted to hospital (Special surgical hospital Global Care Surgery in Novi Sad, Serbia) at 9:00 h on day of surgery. All preoperative preparations are done on site (lab., ECG, Anesthesiology exam). None of them didn’t received any mechanical bowel preparation, enemas or laxatives. Per oral nutrition were stopped at midnight, nine to twelve hours prior the operation. Antibiotic prophylaxis started one hour before surgery with single dose of Cephalosporin I’st generation. Laparoscopic operation was performed in the afternoon hours, and discharge from hospital tomorrow at 9:0 h. All operations were in total endotracheal anesthesia. We used one 10 mm trocar inserted in preperitoneal space of Retzius trough small skin and fascial incision in umbilicus and two 5 mm trocars positioned in midline above the pubic bone and 5 cm higher. After closing of skin incisions with intradermal resorbable sutures, we infiltrated operative wounds and preperitoneal space with 20 ml solution made from 10 ml lidocaine 2% and 10 ml bupivacaine. Mobilization of patients started two to five hours after the surgery, same as the postoperative per oral nutrition. Patients did not received any i.v, i.m. or oral analgetic postoperatively. We asked all of them to rate level of postoperative pain 30 min after the operation, and just before discharge, on scale from 1 to 10.
Results: All patients were discharged on first postoperative day. At the moment after the operation 82 patients answered they had pain level 1, 5 pts level 2 and 13pts level 0. At the release moment 76 pts answered level 1 and 24 pts level 0.
Wound cover was removed on day two, after we suggested patients to wash them self free. We didn’t have any postoperative readmissions or early postoperative complications. All operations were performed by the same surgeon and one cameraman. Operative time were 40 to 90 min. (average 55 min.). Blood loss were 0 to 50 ml (average less than 20 ml). No drains were used. Patients come to regular controls after one week and we noticed no recurrence so far.
Conclusions: Laparoscopic total preperitoneal bilateral inguinal hernia repair in total endotracheal anesthesia combined with infiltration of local anesthetic, result with great patients satisfaction because almost complete absence of postoperative pain and possibility of immediate painless movement.
Hernia-adhesions—inguinal hernia
P173—Use of Perioperative Tamsulosin to Prevent Postoperative Urinary Retention Following Day Case Laparoscopic Inguinal Hernia Repair
Thabet Alghazal
King Fahad Specialist Hospital -Dammam, General Surgery, Saudi Arabia
Postoperative urinary retention is one of the more common complications following laparoscopic inguinal hernia repair (LIHR). We hypothesized that the oral @1 adrenergic blocker Tamsulosin, (Flomax, Boehringer Ingelheim) could be used to decrease the incidence of urinary retention after LIHR. Methods: Data from all patients undergoing laparoscopic total extraperitoneal (TEP) inguinal hernia repair by a single surgeon from June 2012 through June 2017 were collected prospectively. Patients received Tamsulosin (Flomax) 0.4 mg/day orally for a total of five days beginning two days prior to surgery. All TEP procedures were done under general anesthesia without a urinary catheter in place. Patients were discharged home after voiding in the recovery area. Data are expressed as mean ± SD. Results: Flomax was administered to 30 of 32 consecutive patients undergoing outpatient TEP inguinal hernia repair. Mean patient age was 51.3 ± 10.5 years (28–72 years). Ten (32.2%) patients were operated on for recurrent inguinal hernias, 14 (45.1%) had bilateral hernias repaired, and 4 (12.9%) had a concomitant umbilical hernia repair. The average operative time was 60 ± 24 min. The mean amount of intraoperative fluids given was 998 ± 297 ml. Two patients were excluded from the study because they required a urinary catheter in the operating room for other reasons (one requiring concomitant cystoscopy and one with anticipated complicated repair in patients who had 3 prior open inguinal hernia repairs and did not take Flomax). None of the patients given Flomax perioperatively developed urinary retention and all were discharged home the same day of surgery. In contrast, the 2 patients undergoing TEP repairs who did not receive Flomax perioperatively both developed urinary retention that required catheter placement. Conclusions: Perioperative administration of Tamsulosin (Flomax) in the setting of laparoscopic inguinal hernia repair under general anesthesia was associated with no cases of postoperative urinary retention in this small pilot study. The use of perioperative Tamsulosin (Flomax) should be evaluated further to determine its impact on the postoperative urinary retention rate following LIHR. This approach has the potential to shorten outpatient recovery room stays, reduce patient risks, and may result in health care savings.
Hernia-adhesions—inguinal hernia
P174—Unusual Complications of Open Preperitoneal Tension-Free Inguinal Hernia Repair
Thabet Alghazal
King Fahad Specialist Hospital -Dammam, General Surgery, Saudi Arabia
Background: The purpose of this study is to report two patients referred to our hospital after developing unusual complications attributed to prior open preperitoneal tension-free inguinal hernia repair. CASE # 1 A 75-year-old male developed a left proximal thigh abscess requiring incision and drainage five years after open prosthetic, preperitoneal inguinal hernia repair with single-layer mesh. A pelvic CT scan demonstrated an abscess in the left inguinal preperitoneal space as well as diverticulosis but no diverticulitis. A colonoscopy was negative for any additional findings. The patient underwent groin exploration, debridement of the inguinal canal and sinus tract, and mesh resection followed by JP drain placement. The inguinal defect was repaired utilizing the Shouldice technique. Intraoperative cultures revealed penicillin-resistant Staphylococcus Aureus. The drain was removed on postoperative day nine, and his recovery remains uneventful without hernia recurrence or infectious complications at 11 months follow-up. CASE # 2 An 82-year-old man developed progressive left lower extremity edema and disabling claudication one month after open prosthetic inguinal hernia repair with a bilayer disc mesh. Venous duplex imaging revealed compression of the left common femoral and external iliac veins. A CT angiogram demonstrated left external iliac and common femoral artery thrombosis and a 5.2 cm fluid collection consistent with hematoma. An IVC filter was placed. The common femoral artery was controlled after initial exploration revealed a common femoral artery pseudo- aneurysm. The mesh was densely adherent to the external iliac vein and was thus not resected. The common femoral artery pseudo aneurysm was repaired and the profunda femoris artery over sewn. An external iliac to superficial femoral artery 8 mm PTFE bypass graft was placed. The patient was discharged on systemic anticoagulation without claudication on postoperative day thirteen.
Summary: Laparoscopic inguinal hernia repair and novel, open techniques and mesh devices have popularized the placement of mesh in the preperitoneal space. Acute, severe vascular complications and latent infectious complications can occur after open, preperitoneal tension-free inguinal hernia repair and may require remedial surgery. CT scans and Angiogram pictures are available. Will be presented as a Poster Presentation.
Hernia-adhesions—inguinal hernia
P175—Surgical skill training in laparoscopic inguinal hernia repair based on an online video library as a supplement to live workshop courses
Kryspin Mitura1, K Kisielewski2, M. Romańczuk2, M Skolimowska-Rzewuska2, D. Wyrzykowska1
1Siedlce University of Natural Sciences and Humanities, Faculty of Medical and Health Sciences, 2Siedlce Hospital, General Surgery Department, Poland
In 2019, a new online library was created containing videos from various stages of laparoscopic inguinal and ventral hernias. The videos are divided into thematic categories. The video collection includes both films presenting new operational techniques as well as lectures. There are full videos without editing and selected fragments that are the essence of hernia repair. Materials posted on the internet are used in training surgeons, which is conducted live. Surgeons need to familiarize themselves with the video before the workshop, and then after the workshop a recording of the operations in which they participated is posted on the channel with additional feedback. In this work, we discuss the impact of the library channel on the effectiveness of training.
Robotics & new techniques—bariatrics
P176—The first experience robotic Nissen fundoplication in a patient with hiatal hernia
Andrii Stasyshyn1, A.A. Hurayevskyy1, A.O. Dvorakevych2
1Danylo Halytskyi Lviv national medical university, Department of surgery and endoscopy, Faculty of postgraduate education, 2Lviv Regional Children's Hospital, Department of Minimally Invasive Surgery, Ukraine
Aim: To analyze the clinical case of the first in Ukraine robotic Nissen fundoplication in a patient with hiatal hernia.
Materials and Methods: Patient K. 50 years old with sliding hiatal hernia, gastroesophageal reflux disease, was hospitalized in Lviv Emergency Care Hospital. 9 December, 2020 was performed robotic Nissen fundoplication.
Results and Discussion: Robotic-assisted operation using da Vinci system (2009) was performed with three—8.5 mm working and two—5 mm laparoscopic instruments. The duration of the operation was 6 h. There were no intra- and postoperative complications. In satisfactory condition for 3 days the patient was discharged home.
Conclusions: Improved stabilized three-dimensional stereoscopic control of the operating field, increased image clarity, hand stabilization technology eliminates the tremor of the surgeon and provides greater confidence in the accuracy of surgical manipulations.
Key words: hiatal hernia, robotic surgery, new methods of treatment.
Robotics & new techniques—bariatrics
P177—Low impact laparoscopic sleeve gastrectomy: technique and preliminary results
Panagiotis Lainas, C. Dammaro, J. Derienne, S. Zervaki, I. Dagher
Antoine-Beclere Hospital, Paris-Saclay University, Department of Minimally Invasive Digestive Surgery, France
Aim: Low Impact Laparoscopy (LIL) is an innovative surgical procedure that combines several perioperative optimizations aiming to reduce aggressiveness of the surgical act. It consists of reducing the size or number of surgical incisions, using low and stable pneumoperitoneum pressure and optimizing perioperative anesthesia. We applied this concept for sleeve gastrectomy (SG) using a single-incision laparoscopic surgery (SILS) technique associated to low and stable pneumoperitoneum of 12 mmHg (instead of 15-16 mmHg non-stable pneumoperitoneum usually used), aiming to decrease aggressiveness on the peritoneum and diaphragmatic domes. The aim of this study is to describe the technique of LIL sleeve gastrectomy (LIL-SG) and report preliminary results.
Methods: LIL-SG starts by introducing a single-port through a 3 cm left hypochondrium or transumbilical incision. The AirSeal® system (AB Medica, Mery-sur-Cher, France) is used to provide stable pneumoperitoneum of 12 mmHg. Anesthetic optimization is provided by anesthetic infiltration of the incision site before insufflation and peritoneal infiltration before exsufflation. Data from consecutive patients who underwent LIL-SG in our department after September 2019 were prospectively collected and analyzed. A preliminary comparison was made using data from patients who underwent conventional SILS SG. Results: Thirty patients underwent LIL-SG (mean age: 37.1 years; mean BMI: 40.5 kg/m2). A pneumoperitoneum of 12 mmHg was used throughout the whole procedure in 21 patients (70%). It was increased to 14 mmHg in 9 patients (30%) for an average of 12.7 min due difficulties in oesogastric junction exposure, gastrolysis or stapling. No intraoperative complications, conversion or addition of trocars were observed. Mean operative time was 61 min. Post-operative care was uneventful for all patients but one (pulmonary infection). Average theoretical length of hospital stay (Chung score) was 2.2 days. A preliminary comparison with 30 patients who underwent conventional SILS SG with similar preoperative data showed that LIL-SG reduces significantly postoperative pain and usage of opioid painkillers, as well as length of hospital stay (p = NS).
Conclusions: LIL-SG is a feasible and safe technique with good results regarding perioperative morbidity. Our preliminary results show that LIL-SG appears to decrease postoperative pain, postoperative opioid painkiller usage and allows better recovery in severely obese patients undergoing laparoscopic SG.
Robotics & new techniques—basic and Technical research
P178—Negative pressure therapy, minimally invasive and accessible technique in the treatment of Extensive Subcutaneous Emphysema
Álvaro Soler-Silva, Luis Sanchez-Guillen, A.F. Sanchís-López, C. Lillo, L. Sánchez-Guillén, S .Lario Pérez, M. Bosch, D. Triguero, I. Oller, A. López-Rodríguez, A. Arroyo
Elche University Hospital, Alicante, Spain., Department of General Surgery, Colorectal Unit., Spain
Introduction: Extensive subcutaneous emphysema (ESE) is a complication that may be found after invasive procedures such as chest tube (CT) placement, which may worsen the patient’s prognosis.
Traditionally, numerous surgicals treatments have been described: video-assisted thoracoscopic surgery (VATS), "blow hole" incisions, the placement of multi-perforated needles or drains. However, some of these techniques are limited in critical patients and increase risk of infection in SARS-COV2 patients. So it is necessary to employ new more effective, less invasive and isolated procedures.
Description of technique: We present the technique in a case of ESE, secondary to a removal of a CT, placed in order to drain a left pleural effusion, in an 84-year-old male patient who was in a post-surgical critical unit. Patient developed a subcutaneous emphysema in the armpit and left chest that was treated conservatively (FIgure 1A); however, 4 days after the withdrawal, it evolved to ESE affecting chest and mandibular branches (Fig. 1B). It was decided to apply a new technique with negative pressure therapy (NPT), following these steps (Fig. 2), obtaining complete resolution in 5 days (Fig. 1C): A. Locate the emphysema area; B. Make two simple incisions in the subcutaneous cellular tissue; C. Fill them with hydrophobic reticulated polyurethane sponge (HRPS); D. Cover them with two larger HRPS fragments to connect both incisions; E. Put a perforated dressing; F. Placement of the dressing with aspirative drainage and connect the NPT device in the continuous therapy mode (-150 mmHg) during 5 days.
Conclusion: NPT is an effective and low invasive strategy for the management of EES in critical patients or SARS-COV2 patients.

Robotics & new techniques—basic and technical research
P179—The laparoscopic performance of 8 K Ultra-High-definition/two-dimensional (2D) and 2 K high-definition/three-dimensional (3D) monitors by medical studen
Tatsuya Shonaka, C. Tani, H. Iwata, Y. Adachi, T. Takeda, M. Otani, K. Hasegawa, N. Matsuno, H. Furukawa, A. Yoshida, S. Yasuo
Asahikawa Medical University, Department of Surgery, Japan
Objective: 8 K Ultra-High-definition (UHD) has been developed in accordance with the advancement of imaging technologies. Three-dimensional (3D) imaging improves laparoscopic surgical performance in comparison to a two-dimensional (2D) monitor. However, the difference between 8 K-UHD and 3D laparoscopy has not been investigated. We evaluated the laparoscopic procedures performed by medical students using 2 K/2D, 2 K/3D and 8 K/2D monitors, especially focused on the depth perception.
Methods: Nine medical students were enrolled. They performed two tasks using 2 K/2D, 2 K/3D and 8 K/2D monitors. Two task performance was evaluated. They were asked to grasp three metal rods with forceps using each hand (Task 1). They were asked to grasp a metal rod with forceps held in the right hand, passed the metal rod through a metal ring, and transferred it to their left hand (Task 2). After the task was finished, the participants completed a five-stage questionnaire survey that evaluated their impression of each monitor.
Results: The average time taken perform Task 1 with the right hand using 2 K/2D, 2 K/3D, and 8 K/2D was 19.8 ± 7.4 s, 14.1 ± 4.6 s, and 28.1 ± 11.6 s, respectively. When performed with the dominant hand, procedures performed using 2 K/3D took significantly longer than when using 8 K/2D (p = 0.04). The average time taken to perform Task 1 with the left hand using 2 K/2D, 2 K/3D, and 8 K/2D was 21.5 ± 7.0 s, 14.7 ± 5.6 s, and 22.5 ± 8.1 s, respectively. There was no significant difference between the 3 groups in procedures performed by the non-dominant hand. The average time of Task 2 using 2 K/2D, 2 K/3D, and 8 K/2D was 31.3 ± 21.7 s, 13.1 ± 6.7 s, and 12.0 ± 4.9 s, respectively. The procedure time of 2 K/2D was significantly longer than that of 2 K/3D and 8 K/2D (P = 0.02). The procedure time of 2 K/3D and 8 K/2D was almost the same. The order of preference for the monitors (preferred to less preferred) was rated as follows: 2 K/3D, 8 K/2D and 2 K/2D. The 2 K/3D monitor was considerd the best monitor for depth perception.
Conclusion: 2 K/3D is superior to 8 K/2D for forceps procedures performed using the dominant hand. However, when the movement of both hands was coordinated (“bi-hand coordination”), the laparoscopic procedures performed 8 K/2D were almost the same as those performed 2 K/3D.
Robotics & new techniques—colorectal
P180—Treatment of neonatal bowel duplication trough a mini-invasive techniques combination
Carlos Cadaval Gallardo1, M.M. Rodríguez Lima2, I. Ruiz Jiménez1, F. Ravinovich3, S. Valverde3, L. Toselli3, M. Martínez Ferro3
Badajoz Maternal and child Hospital, 1Pediatric Surgery, 2Pediatric Urgencies and Emergencies, Spain. 3Maternal and Child Hospitalary Fundation of Buenos Aires, Pediatric Surgery, Argentina
Aims: To report a case of neonatal intestinal duplication with an 80% involvement of the abdominal cavity, operated successfully by combining various minimally invasive surgical techniques.
METHODS: Case report. Full-term newborn patient with 2835 g of weight who consulted for a palpable abdominal mass on the 3rd day of life.
We made Ultrasound and CT of the abdomen, which describe a cystic abdominal mass of 40 × 40 and 60 × 30 mm in the different planes, with homogeneous content that occupies the entire lower abdomen and displaces adjacent structures. Blood analysis with negative tumor markers.
It was decided to perform exploratory laparoscopy on the 5th day of life, wich is described a continuation:
First time: Patient in supine position. 3 working ports are used, 1 umbilical of 4 mm and 2 on both flanks of 3 mm. Ileal duplication of 10 cm in length is visualized (Fig. 1). Puncture aspiration of the content was performed under laparoscopic vision, obtaining a mucosal-meconial aspect content.
Second stage: Transumbilical exteriorization of the lesion and affected ileal segment by umbilical port. Resection and end-to-end anastomosis was performed.
Results: Oral tolerance on the third postoperative day and discharge on the eighteenth day for reasons not related to surgery. Favorable follow-up. Pathological anatomy compatible with grade IIb ileal duplication. (Fig. 2).
Conclusions: The combination of minimally invasive surgical techniques such as laparoscopy, puncture aspiration and transumbilical exteriorization appear to be a safe and reproducible method in the treatment of neonatal intestinal duplications and other bening abdominal lessions, reducing the risk of complications such as infection, eventration or dehiscence associated with large incisions in the newborn, minimizing postoperative pain and obtaining excellent cosmetic results.

Robotics & new techniques—colorectal
P181—Safe splenic flexure mobilization: the “shaving” technique
Caterina Accardo, D. Cassini, F. Di Candido, M. Ardu, A.G. Epifani, E. Bevilacqua, G. Baldazzi
Sesto San Giovanni Hospital, University of Milan, Complex Unit of General, Minimally Invasive and Emergency Surgery, Italy
Aims: Routine splenic flexure mobilization is a debated topic. During left colectomy, it has been performed to reduce nastomotic leak with a tension-free anastomosis.Technical accuracy with gentle dissection can reduce the rate of splenic injury. We propose our “shaving” technique to perform a safe dissection and to minimize intraoperative complications.
Methods: We retrospectively reviewed all left colectomy and total mesorectal excision performed by a colorectal surgical group over 12-year period. We analyzed surgical technique and intraoperative and postoperative outcomes of minimally invasive cohort.
Results: 837 colorectal minimally invasive procedure were included. Overall, indications were cancer (56%), diverticulitis (31%), and other benign diseases (13%). Exclusion criteria are: splenic flexure cancer, locally advanced tumor, multiorgan resection. Only 1% of splenic flexure mobilization required conversion. There where 5% of complications: bleeding, bowel injury, pancreatic injury. No splenectomy or splenorrhaphy are required.
Conclusions: Laparoscopic technical accuracy with gentle dissection and direct visualization of the embriological planes can reduce the rate of iatrogenic splenic injury. The technique that we porpose is relatively safe and repricable even for less experienced surgeons.
Robotics & new techniques—colorectal
P182—Minimally invasive, ‘en-bloc’ seminal vesicle excision for locally advanced rectal adenocarcinoma-initial experience
Diwakar Pandey1, A.L. deSouza2, S. Bankar2, V. Sukumar2, B. Rajkumar2, J. Rohila2, A.P. Saklani2
1Balco Medical Centre, Division of Surgical Oncology, 2Tata Memorial Centre,Homi Bhabha National Institute, Division of Colorectal Services, Department of Surgical Oncology, India
Background: Isolated seminal vesicle abutment/invasion is a rare occurrence in patients with locally advanced rectal adenocarcinoma. This study evaluates the perioperative outcomes of minimally invasive ‘en -bloc ‘seminal vesicle excision, preserving both the bladder and the prostate.
Material and Methods: A retrospective review of prospectively maintained database at a tertiary cancer centre, identified 10 successive patients who underwent a minimally invasive en-bloc resection of one or both seminal vesicles for locally advanced, non-metastatic rectal adenocarcinoma between May 2016 and December 2019. Perioperative outcomes including blood loss, margins status, lymph nodal yield and perioperative morbidity were evaluated. Rates of local and distant recurrence were defined.
Results: Five patients underwent a laparoscopic procedure while the remaining 5 received a robotic resection. (Fig. 1) There was one conversion to open surgery, this was in a robotic procedure. Five patients had cT4 tumours at presentation while the remaining 5 had seminal vesicle abutment on MRI i.e. cT3. All patients received neoadjuvant chemoradiation with or without consolidation chemotherapy. The mean age at presentation was 45.20 years (range 33-64 years) and the mean body mass index was 21.6 kg/m2 (range 16–32 kg/m2). The median blood loss and hospital stay was 250 ml (range 100-1200 ml) and 9 days (range 5-17 days) respectively. Serious complications (Clavien-dindo ≥ IIIb) were seen in 2 patients (20%). All patients underwent R0 resection with a median nodal harvest of 9 nodes (range 4–24). At a median follow up of 10.5 months (range 2-47 months) 2 patients developed distant metastasis [lung metastasis (1 patient); peritoneal disease (1 patient)]. There was no local recurrence or mortality till the last follow up.
Conclusion: Minimally invasive, en-bloc resection of one or both seminal vesicles for locally advanced rectal adenocarcinoma, is feasible in a select group of patients with 100% R0 resection rate in this series. Follow up data is essential to determine the long-term outcomes of this resection template. Keywords-locally advanced rectal cancer, en-bloc seminal vesicle excision, short term outcomes,minimally invasive surgery (Table 1).
Table 1.
Patient details – listed in chronological order of date of surgery
| Case | Age | cTNM | Neoadjuvant treatment | Type of Surgery | Procedure | Blood loss (ml) | Hospital stay (days) | pTNM | Complications | Clavien-Dindo Grade |
|---|---|---|---|---|---|---|---|---|---|---|
| 1 | 33 | cT4bN2M0 |
NACTRT(50 Gy/25#) 2#CapeOx |
Laparoscopic | LAR + b/l seminal vesicle | 1200 | 9 | ypT4bN0 | None | 0 |
| 2 | 47 | cT4bN2M0 | NACTRT(50 Gy/25#) | Laparoscopic | ISR + b/l seminal vesicle + Rt PLND | 200 | 6 | ypT3N1 | Urinary Incontinence | I |
| 3 | 42 | cT3N2M0 | N5ACTRT(50 Gy/25#) | Laparoscopic | LAR + b/l seminal vesicle | 200 | 8 | ypT2N0 | Urinary incontinence | I |
| 4 | 51 | cT3N2M0 |
NACTRT(50 Gy/25#) 4#CapeOx |
Robotic | ISR + Rt seminal vesicle | 250 | 6 | ypT3N0 | None | 0 |
| 5 | 50 | cT3N2M0 |
NACTRTT(50 Gy/25#) 4#CapeOx |
Laparoscopic | LAR + Rt seminal Vesicle | 400 | 11 | ypT0N0 | Colonic conduit ischemia | IIIb |
| 6 | 64 | cT4bN2M0 |
NACTRT(50.4 Gy/28#) 3#CapeOx |
Robotic | APR + Lt seminal vesicle + Rt PLND | 200 | 17 | ypT0N0 | Obstructive jaundice (CBD stone) | IIIa |
| 7 | 34 | cT4bN1M0 | NACTRT(50 Gy/25#) | Robotic | LAR + Rt seminal vesicle | 250 | 5 | ypT0N0 | None | 0 |
| 8 | 60 | cT4bN2M0 | NACTRT(50 Gy/25#) | Robotic converted to open | Hartmann + b/l seminal vesicle | 400 | 13 | ypT0N0 | SSI, uretero-rectal fistula | IIIa |
| 9 | 37 | cT3N1M0 |
NACTRT(50 Gy/25#) 4#CapeOx |
Robotic | APR + b/l Seminal vesicle excision | 100 | 13 | ypT3N1 | Colonic conduit ischemia | IIIb |
| 10 | 34 | cT3N1M0 |
NACTRT(45 Gy/25#) 4#CapeOx |
Laparoscopic | ISR + b/l seminal vesicle | 250 | 9 | ypT4bN0 | Urinary retention | I |
NACTRT Neoadjuvant chemoradiation, LAR low anterior resection, b/l bilateral, PLND pelvic lymph node dissection, ISR intersphincteric resection, APR abdominoperineal resection, SSI Surgical site infection, CBD Common bile duct
Robotics & new techniques—colorectal
P183—Intraoperative ICG fluorescence for ureteral identification in laparoscopic colorectal surgery: preliminary results of a prospective study
Biagio Picardi1, S. Rossi1, G. Mazzarella1, E. Muttillo2, S. Rossi Del Monte1, I. Muttillo1
1San Filippo Neri Hospital—ASL Roma 1, General and Emergency Surgery, 2La Sapienza University of Rome, General Surgery, Italy
Aims: Although minimally invasive surgery have demonstrated proven benefits in colon and rectal resections, the rate of ureteral injury increased in laparoscopic approaches. Furthermore, in complex resections such as locally advanced tumors that can englobe the ureters or massive abdominal inflammation there is an increased risk of ureteral injury with all its serious systemic consequences.
Indocyanine green (ICG)-enhanced fluorescence was introduced in laparoscopic surgery to improve the view and provide real-time identification of anatomical structures such as biliary ducts, vessels and lymph nodes.
This prospective study examines the effectiveness and the preliminary results in our experience of near-infrared ICG fluorescence of the urinary tract to prevent ureteral injuries in complex laparoscopic colorectal resections (CLCR).
Methods: Patients undergoing CLCR were enrolled prospectively from June 2020. CLCR are defined as locally advanced colon cancer, low rectal cancer, complicated diverticulitis, endometriosis and inflammatory bowel disease. All patients received preoperatively placement of ureteral stent and intraoperatively intraureteral administration of ICG.
Moreover, in any case patients received intravenous 25 mg of ICG for intraoperative assessment of bowel perfusion before and after packaging the anastomosis, performing a double pre-anastomotic evaluation of the serous and mucous-side simultaneously and finally, in case of anterior rectal resections, we also carried out endoluminal control of the anastomosis.
Primary endpoint is intraoperative ureteral injury rate. Secondary endpoints include fluorescence assessment, added operative time, postoperative complications and reoperations. Data were collected prospectively.
Results: 6 patients (3 male and 3 female) underwent CLCR with real-time ICG fluorescence imaging of ureter. We performed 2 total mesorectal excision (TME) for rectal cancer and 1 left hemicolectomy for diverticulitis, in election; 2 left hemicolectomies (1 for diverticulitis and 1 for sigmoid cancer) and 1 rectal resection for rectal cancer, in delayed emergency setting. All interventions were laparoscopic with no case of conversion. Ureter was successfully detected in 6 (100%) interventions. Intraureteral ICG injection dose was 12.5 mg and mean added operative time for the stent placement was 25 min (range 20 – 30). Fluorescence visualization of ureters lasted throughout the surgery. No adverse effects on dye injection were reported in the case studies. Patients did not report ureteral injury and postoperative complications. 1 patient experienced an intraoperatively iatrogenic perforation that required a re-laparoscopy in 1° postoperative day (Clavien-Dindo grade IIIb). Mean lenght of stay was 5.6 days (range 4 – 9).
Conclusions: Intraureteral near-infrared ICG fluorescence provides safety and efficacy with no significant time consuming to prevent ureteral injury during laparoscopic colorectal resections with increased risk of iatrogenic lesions. A prospective study is ongoing to confirm these results.

Robotics & new techniques—colorectal
P184—Results of robotic colectomy with icg-angiography and intraoperative colonoscopy
Jaime López-Sánchez, Pedro Montalbán, R Díaz-Maag, J Alcázar, F Blanco, M Angoso, J Sánchez-Tocino, S Garrosa, J García, L Muñoz-Bellvís
Hospital Universitario de Salamanca, General and Gastrointestinal Surgery, Spain
Aims: The aim of the study was to evaluate the influence of Robotic Colorectal Surgery (RCS) associated with Indocyanine Green Fluorescent Angiography (ICG-A) and Intraoperative Colonoscopy (IC) on the results of left colectomies.
Methods: Single-center, cross-sectional study of 17 RCS associated with ICG-A and IC was performed during 2018–2019. All procedures were conducted using the da Vinci X Robotic Surgical System. An ICG-A was made prior to colonic section and after the anastomosis. Additionally, a direct assessment and air leak test was carried out using IC.
Results: We performed 17 procedures (8 sigmoidectomy and 9 anterior resection). Most of the patients were males (64.7%), with overweight (BMI 26.4 kg/m2) and average age of 70 years. Colorectal cancer was the diagnosis in majority of the patients (most of them were pT3pN0 and tumor-free surgical margins were observed in all cases). The average number of isolated lymph nodes was 15 nodes and the lymph node ratio was 0.06. The average surgical time was 236 min. Postoperative complications appeared in 6 patients and 1 patient developed an anastomotic leak. Change of section line based on ICG-A occurred in 1 patient. During the IC, we observed three intraoperative complications (two staple line bleeding and one anastomotic leak).
Conclusions: The enhancement and combination of innovative techniques such as RCS, ICG-A or IC can improve the results of colorectal surgery. Some of the advantages of RCS are 3D vision, stable and magnified image and physiologic tremor filtering, while IC and ICG-A allow intraoperative vision and evaluation of anastomoses.
Robotics & new techniques—education
P327—Robotic surgery after stent insertion for obstructed rectosigmoid colon cancer with suspicious paraaortic lymph node metastasis and invasion to the uterus
Sung Uk Bae, W.K. Jeong, S.K. Baek
Keimyung University Dongsan Hospital, Surgery, Korea
Robotic colorectal surgery offers technical advantages to complex surgeries such as combined resection for direct invasion to adjacent organs. Self-expanding metallic stents (SEMS) are increasingly used as a bridge to subsequent elective surgery for obstructed colon cancer. Although the role of paraaortic lymph node dissection in the management of colorectal cancer has not been established, this extended lymphadenectomy might be beneficial in carefully selected patients. We present a video presentation of robotic surgery for obstructed rectosigmoid colon cancer with paraaortic lymph node metastasis and direct invasion to uterus and adnexa. An 81-year-old woman was referred to our hospital and colonoscopy revealed a huge, ulcerated mass encircling the lumen with complete obstruction and a SEMS was inserted under fluoroscopic guidance. Abdominal computed tomography and radionuclide positron emission tomography of the torso revealed a rectosigmoid colon cancer with paraaortic lymph node metastasis and direct invasion to the uterine fundus and right ovary. Histopathological examination of the specimen showed a moderately differentiated T4bN2bM1a adenocarcinoma measuring 9.1 × 6.2 cm in size. The total and positive lymph nodes harvested were 35 and 8, respectively. The lesion on the right ovary was diagnosed as metastatic carcinoma, secondary to the large intestine tumor. The patient has received 6 cycles of Avastin/FOLFOX chemotherapy with no recurrence during the 14 months follow up period. Based on the present case, robotic resection for locally advanced colorectal cancer with invasion to adjacent organs can be performed safely and facilitate various kinds of combined resections in selected cases.
Robotics & new techniques—education
P185—Experimental training model for the transanal minimally invasive approach-concept and development.first results
Calin Popa1, D. Schlanger1, V. Prunoiu2, P. Puia1, A. Ciocan1, F. Zaharie1, C. Pestean3, I.C. Puia1, N. Al Hajjar1
1Regional Institute of Gastroenterology and Hepatology Surgery, Cluj-Napoca, Surgery, 2Oncological Institute Bucharest, Surgery, 3Faculty of Veterinary Medicine, Anesthesiology, Cluj-Napoca, Romania
Aim: Development of tubular physical systems and specific exercises that can be included in a standardized training program for the transanal minimally invasive approach.
Materials and method: Three tubular work systems (Fig. 1) were designed and developed with different inner diameters (5, 7.5 and 12 cm) for performing training exercises (with the purpose of initiating accommodation and coordination) using synthetic materials and biological material – pig stomach (more complex tasks: dissection, excision and suturing) (Fig. 2). We used surgical instruments that are specific to laparoscopic surgery and two dedicated work platforms.
In this stage, twenty general surgery residents were included, without experience in transanal minimally invasive surgery, but with different backgrounds in laparoscopic surgery. They were divided into 10 teams. The residents performed five accommodation and coordination exercises using the 5 and 7.5 cm diameter systems: Grains, Circles, Matches, Teddy Bears, Finger Glove and three exercises using the biological material (on the 12 cm diameter system): Submucosal dissection, Tumor excision and Suture. Exercises were done after a previous theoretical training.
Results: All residents performed the exercises proposed in the "step by step" system. Working time, technical limitations, the participants’ opinion and the trainers’ evaluation have validated the following exercises: Grains, Matches, Teddy Bears, Submucosal Dissection and Suturing in order to be used with the corresponding tubular systems in a standardized training system. The Circles and Finger Glove were considerate inappropriate to be done using a 5 cm diameter system. For the Tumor Excision exercise modifications were made in order to be included in the training program.
Conclusions: The three fixed tubular systems can be used by general surgery residents for initial training in transanal minimally invasive surgery. The proposed standardized exercises could be included into a “step by step” training program. More residents need to be enrolled in a program in the next phase (post COVID era) of the development process, to validate our proposed training program.

Robotics & new techniques—education
P186—Standarized training programme to adquire the technical skills to use the Flexdex Surgical System
José F Noguera, Lourdes García, L García, L Castro, J Garcia, M Maria
Complejo Hospitalario Universitario A Coruña, General Surgery, Spain
The field of laparoscopic surgery has experienced exponential growth in recent years. Despite great progress in this field, standard laparoscopic tools have not been optimally developed and still has some deficiencies when it comes to mobility and ergonomics.
Robotic surgery has attempted to solve these problems by improving the articulation of surgical instruments. However, it presents a series of disadvantages, among which are its high cost and the need for a specific training, which conditions its profitability and which has not allowed its wide use.
In this context, the FlexDexTM surgical instrument is presented as an alternative that combines the precision and range of motion of robotic surgery, with the increased availability of conventional laparoscopy (Fig. 1).
We present a standarized training programme to adquire the minimal technical skills to perform a clinical use of the Flexdex Surgical System. The training activities start with a surgical model to learn the use of the instrument and to have the correct eye-hand coordination (Fig. 2). The second step is the training in ex-vivo animal models to learn to perform a correct suture in organic tissue. The final part of the training programme runs with live animals (pig, white large) in which the surgeons must adquire the skills to perform a correct suture with Flexdex system obtaining the certification of the trainers attending to the quality of the procedure and the employed time in the surgical procedure.
The certification of the training programme is in our hospital a mandatory requirement to use the Flexdex surgical system.

Robotics & new techniques—flexible surgery
P187—The possibility of a robotic approach in diaphragmatic defect
Ana Lozano Nájera, Paula Martínez Pérez, E. Toledo Martínez, P. Martínez Pérez, M.S Trugeda Carrera
Hospital Universitario Marqués de Valdecilla, General Surgery, Spain
Aims: Morgagni's hernia is a rare and congenital diaphragmatic defect. It is often asymptomatic and is diagnosed in adulthood. The thoracic or abdominal symptoms are variable depending on the herniated viscera. Diagnosis is made by imaging tests and the treatment is primarily surgical. The objective is to present a case of Morgagni’s hernia treated by surgically robotic approach.
Methods: The case of 78-year-old woman is presented. She has repeated vomiting and weight loss. A complete study of the patient is carried out. As a finding to be highlighted, the abdominal CT shows a large Morgagni hernia. This hernia has a portion of the colon and the gastric chamber in its hernial sac. Therefore, it is decided to perform hernia repair using a robotic approach.
Results: The intervention revealed a hernia of 10 cm in diameter with the stomach, transverse colon and omentum inside hernial sac. The viscera are reduced to the abdominal cavity. The intrathoracic hernial sac is completely dissected and divided. The hernial orifice is closed with two continuous sutures. Subsequently, titanized mesh is placed and fixed with loose stitches. There are not complications in the postoperative period. Finally, in the consultation, the patient's clinic has improved, she eats better, without nauseas and she has gained weight.
Conclusion: The surgical approach to Morgagni's hernia can be performed robotically. This approach allows better access and visualization of the hernia. In addition, the management of the viscera during their reduction to the cavity and the removal of the hernial sac is carried out more easily. The articulation of the instruments allows the placement and fixation of the mesh to be easier. Therefore, the robotic approach to treat the Morgagni's hernia is safe and provides some advantages.
Robotics & new techniques—flexible surgery
P344—Laparoscopic approach of foreign bodies complications. a case report
Maria Alonso Grela, P. Martinez Perez, R. Fernandez Santiago
Hospital Universitario Marqués De Valdecilla, Cirugía General Y Del Aparato Digestivo, Spain
Introduction: Foreign bodies may cause several complications with important morbidity. A wide variety of foreign bodies are ingested intentional or by accident. In the majority of cases, these objects are expelled by coughing, vomiting or even by bowel movements. The risk for complications such as obstruction, perforation and penetration depends on the nature of the object. Those with sharp edges have the highest risk for complications and laparoscopic approach is a safe way to solve them.
Material and Methods: We present the case of a 63-year.old woman who came to the emergency department of our center with fever and abdominal pain of almost a week evolution. On physical examination she showed soft depressible but painful abdomen. Laboratory tests were normal.
The patient was already known in our department because she was admitted two years ago with a similar clinical condition. At that time, a CT was performed, showing an intra-abdominal fluid collection with a foreign body, compatible with a fishbone, inside of it. The patient was managed conservatively with antibiotics and she was discharged without immediate complications.
At this time, another CT scan was made showing the same collection with the fishbone inside. Firstly, we tried conservative management again with antibiotics but due to the persistence of the inflammatory process, we decide to perform an exploratory laparoscopy.
Results: The patient was operated by laparoscopic approach. We found an inflammatory plastron form the omentum to the right pararectal abdominal wall, including a small bowel loop. A cavity inside the plastron was then identified showing the fishbone which could be then removed by the Hasson supraumbilical trocar. The patient was discharged the third day after surgery without complications.
Conclusions: The use of laparoscopy is a safe and useful technique for the treatment of complications related to intra-abdominal foreign bodies.

Robotics & new techniques—liver
P188—Laparoscopic radical and conservative surgery of hydatid liver echinococcosis. PSM based comparative analysis of immediate and long-term outcomes
Natalia Elizarova1, M. Efanov1, R. Alikhanov1, Z. Azizzoda2, K Kurbonov2, I. Kazakov1, A. Vankovich1, O. Melekhina1, Y. Kulezneva1, V. Tsvirkun1
1Loginov Moscow Clinical Scientific Center, HPB Surgery Department, Russia. 2Avicenna Tajik State Medical University, Department of Surgical Diseases № 1, Tajikistan
Aim: To compare of the immediate and long-term outcomes after laparoscopic radical and conservative cystectomies.
Methods: HPB center (center 1) and general surgery hospital in endemic area (center 2) participated in retrospective study. Radical surgery included total, subtotal pericystectomy and liver resection. Conservative surgery comprised cystectomy with or without partial pericystectomy.
Results: Totally there were 204 patients. Laparoscopic cystectomy was performed in 97 (47%) patients. Radical (n-40) and conservative (n-61) laparoscopic procedures were performed in center 1 and center 2, respectively. Twenty-five pairs of patients were matched. The length of hospital stay and time of abdominal drainage were significantly shorter after radical surgery before and after propensity score matching. The rate of severe morbidity did not differ. The mean follow-up length was 34 and 45 months in center 1 and center 2, respectively. There were no differences in the disease recurrence rate.
Conclusion: Laparoscopic radical surgery usage led to a reduction of the treatment time and can be recommended as the preferred surgical technique in a specialized HPB center.
Robotics & new techniques—pancreass
P189—Comparison between Robotic and Open Pancreaticoduodenectomy with Blumagrt Pancreaticojejunostomy
Shin-E. Wang
Taipei Veterans General Hospital, Surgery, Taiwan
Background: This study is to clarify the feasibility of robotic pancreaticoduodenectomy (RPD) in terms of surgical risks, clinically relevant postoperative pancreatic fistula (CR-POPF), and oncological outcomes compared to open pancreaticoduodenectomy (OPD) by using propensity score matching. Traditional OPD and RPD have been compared only in small, retrospective, and non-randomized cohort studies with variable quality.
Methods: Prospectively collected data for PD were evaluated. Comparison between RPD and OPD was carried out after propensity score-matching.
Results: There were 117 RPD and 128 OPD cases during the study period. After propensity score matching, 87 cases were included for comparison in each cohort. Longer operation time, less blood loss, more lymph node harvested, and less gastric atonia were noted in the RPD cases. There was no significant difference regarding the overall postoperative complications by Clavien-Dindo classification, postpancreatectomy hemorrhage, wound infection rate, and postoperative hospital stay. CR-POPF was not significantly different between RPD and OPD regardless of the Callery risk factor, with overall CR-POPF of 8.0% by RPD and 12.6% by OPD after propensity score matching. The survival outcome for overall periampullary malignancy was significantly better in the RPD group. However, there was no survival difference between RPD and OPD when the comparison was specifically performed for each primary periampullary malignancy.
Conclusion: RPD is associated with less blood loss, less gastric atonia, and more lymph node yield. Propensity scored-matched analysis revealed that RPD is not inferior to OPD in terms of CR-POPF, surgical risks, and survival outcomes.
Robotics & new techniques—pancreass
P190—Oncological feasibility and survival outcomes by robotic pancreatoduodenectomy for pancreatic cancer
Yi-Ming Shyr
Taipei Veterans General Hospital, Surgery, Taiwan
Background: This study is to clarify the oncological feasibility of and justification for robotic pancreaticoduodenectomy (RPD) in patients with pancreatic adenocarcinoma.
Methods: A 1-to-1propensity score-matched comparison of RPD and open pancreaticoduodenectomy (OPD) was performed based on six covariates commonly used to predict the survival outcome for pancreatic adenocarcinoma.
Results: A total of 130 patients were enrolled, with 65 in each study group after propensity score matching. The median operating time was longer for RPD (8.3 h vs. 7.0 h, P = 0.002). However, RPD was associated with less blood loss, lower overall surgical complication rate, and lower incidence of delayed gastric emptying. The resection radicality was oncologically similar between these two groups, but the median lymph node yield was higher for RPD (18 vs. 16, P = 0.038). Before propensity score matching, the 5-year survival was better in RPD (27.0% vs. 17.6%, P = 0.006). After matching, there was still a trend towards improved overall survival in the RPD group; however, the difference in 5-year survival between RPD and OPD was not significant (24.5% vs. 19.7%, P = 0.088).
Conclusion: RPD is not only technically feasible without increasing surgical risks but also oncologically justifiable without compromising survival outcome.
Robotics & new techniques—pancreass
P191—Delayed gastric emptying after pancreaticoduodenectomy
Volodymyr Kopchak, O. Lytvyn, S. Motelchuk
Shalimov National Institute of Surgery and Transplantology, Department of Pancreatic and Bile Ducts Surgery, Ukraine
Purpose: Delayed gastric emptying (DGE) remains a common problem after pancreaticoduodenectomy.
Method: Pancreaticoduodenectomy was performed in 50 patients according to standard methods. 15 (30%) patients underwent pyloric-preserving pancreaticoduodenectomy (PPPD), of which 6 (40%) were diagnosed with DGE, 35 (70%) patients underwent traffic rules by the method of Whipple, of whom 8 (22%) were diagnosed with DGE.
Results: Pancreaticoduodenectomy was performed in 50 patients. PPPD with antecolic manual duodenojejunostomy in 15 (30%) patients; PD with antecolic manual gastrojejunostomy in 32 (64%), with retrocolic manual gastrojejunostomy in 3 (6%). The average time of PPPD is 369—(300–425) minutes, PD—452 (320–760) minutes. The volume of intraoperative blood loss in PPPD was 367 (200–600) ml, PD—436 (200–1200) ml. The time of postoperative stay of the patient in the hospital is 20.8 (12–42) days after PPPD and 15.4 (9–26) days after pancreaticoduodenectomy without pylorus preservation. Slowing of delayed gastric emptying was diagnosed in 14 (28%).
Conclusions: Preservation of the pylorus during traffic rules contributes to a higher level of slowing of gastric emptying than during resection of the pylorus. Given the small sample size of patients, it is difficult to assess the effect on the rate of slowing of gastric emptying in retrocolic or antecolic digestive anastomosis. Further development and evaluation of methodologies is needed.
Keywords: Delayed gastric emptying (DGE); Pancreaticoduodenectomy of Whipple (PD); Pylorus-preserving pancreaticoduodenectomy (PPPD); Antecolic; Retrocolic.
Robotics & new techniques—pancreass
P192—Robotic dual-console distal pancreatectomy: could be considered a new and safe surgical teaching? An observational cohort study
Alberto Balduzzi, M. De Pastena, R. Salvia, S. Paiella, G. Deiro, E. Bannone, T. Giuliani, L. Casetti, M Ramera, G. Montagnini, L. Landoni, A. Esposito
General and Pancreatic Surgery, Pancreas Institute, University of Verona Hospital Trust, Verona, Italy
Background: The study aims to assess the safety and feasibility of the robotic dual-console during a robotic distal pancreatectomy.
Methods: The data of the consecutive patients submitted to RDP from 2012 to 2019 at the Verona University were retrieved from a prospectively maintained database. The patients submitted to RDP using the dual-console platform (DG) were compared to the standard robotic procedure (SG).
Results: During the study period, 102 robotic distal pancreatectomies were performed, of whom 42 patients (41%) were submitted to dual-console technique (DG), and 60 patients (59%) underwent the standard procedure (SG). Higher operation time was recorded in the DG compared to the SG (410 vs. 265 min, p < 0.001). The overall conversion rate of the series was 7% (n°7 patients). All the conversions were observed in the SG (p = 0.021). No differences in morbidity or pancreatic fistula rate were recorded (p > 0.05). No mortality events in the 90th postoperative days were reported in this series.
Conclusions: The robotic dual-console approach for distal pancreatectomy is safe, feasible, and reproducible. The postoperative surgical outcomes are comparable to the standard RDP with the single-console da Vinci Surgical System®. This surgical technique can widely and safely improve the robotic surgical training program Tables 1 and 2.
Table 1.
Demographic intraoperative and pathological data

Table 2.
Postoperative data

Robotics & new techniques—solid organs
P193—Unconventional complications of transaxillary robotic assisted thyroidectomy (RATT): myth or truth?
Leonardo Rossi, P. Papini, L. Fregoli, V. Buoni, A. De Palma, G. Materazzi
University Hospital of Pisa, Endocrine Surgery, Italy
Aim: In the last 10 years, robotic assisted transaxillary thyroidectomy (RATT) has spread rapidly, particularly in eastern countries, proving to be a safe and effective procedure. Anyway, new complications have been reported in some case series that have led to criticism regarding this new technique. The aim of the study was to analyse the incidence of complications in a large series of European patients who underwent RATT and to evaluate the impact of new unconventional complications on the safety of the procedure.
Methods: From February 2012 to December 2020, 541 RATT with a single axillary incision using three robotic arms were performed at the University Hospital of Pisa. Complications were divided into two groups: Group A (conventional) and Group B (unconventional). Conventional complications included: bleeding; recurrent laryngeal nerve (RLN) transient and definitive palsy; transient and definitive hypoparathyroidism. All the other complications were considered unconventional.
Results: A total of 4 male and 537 female patients were included: 336 (62.1%) underwent hemithyroidectomy, whereas 203 (37.5%) underwent total thyroidectomy and 2 isthmusectomy (0.4%). The overall rate of post-operative complications was 4.6%. Group A included a total of 22 complications (4.1%): bleeding occurred in 6 patients (1.1%), among which two required reintervention and four were treated conservatively with local compression; RLN transient palsy occurred in 7 cases (1.3%), whereas RLN definitive palsy occurred in one case (0.2%); transient hypoparathyroidism occurred in 8 cases (1.5%). Concerning Group B, 4 unconventional complications were registered (0.8%): one case of ulnar nerve traction injury (0.2%), one tracheal injury (0.2%) which required endoscopic treatment and two cases of thyroid tissue reimplantation along the surgical track (0.4%) which required excision.
Conclusions: The overall incidence of post-operative complications in our experience is at the lower limits compared to data reported in literature. Furthermore, the rate of unconventional complications is very low (0.8%). Although surgeons must be aware regarding the possibility of these new complications, due to their rarity they do not impact on the safety of the procedure. Surgeons who have mastered standardized robotic surgical procedures and who are aware of these new potential complications and how to prevent them can perform RATT safely.
Robotics & new techniques—solid organs
P194—Transabdominal robot-assisted partial nephrectomy after liver transplantation
Lorenzo Bernardi, E. Balzano, P. De Simone
University of Pisa, Hepatobiliary and Liver Transplantation Unit, Italy
Background: Management of kidney tumors (KT) after liver transplantation (LT) is challenging due to previous surgery and calcineurin inhibitors (CNI)-related chronic renal dysfunction. Minimally invasive renal-sparing strategies are favored, but a transperitoneal approach may be limited by previous transplant surgery. We report on our experience with robot-assisted partial nephrectomy (RPN) through a transabdominal approach after LT, with the aim to report on its feasibility and safety.
Methods: This was a retrospective analysis on RPN in LT recipients. The study endpoints were to assess the feasibility of a transabdominal approach as conversion to open surgery and incidence of complications.
Results: Five patients (male 80%; median age 62 years, range 56–66) were diagnosed with KT at a median of 13 years (range 8–18) post-LT. The pre-operative work-up disclosed a median of 1 (range 1–2) nodular lesion per patient (4 polar, 2 meso-renal) located in the left (3 patients) or right (2 patients) kidney, and with a median size of 25 mm (range 8–45). All patients underwent RPN; one (case 2, left RPN) required conversion to open surgery due to uncontrolled bleeding. In the remainder of patients, blood losses were not significant. Post-operative course was uneventful and overall median length of hospital stay was 7 days (range 5–10). Histology showed 4 papillary tumors, and one not otherwise specified fibrotic nodule. At a median follow-up of 24 months (range, 1–36) all patients are alive without recurrence.
Conclusions: Even in the setting of LT, transabdominal RPN is feasible and safe, and provides oncological radicality.
KEYWORDS: minimally invasive, robotics, kidney/liver resections.
Robotics & new techniques—solid organs
P195—Robotic assisted adrenalectomy as a treatment approach for patients with adrenocortical carcinoma: current evidence
Eugenia Yiannakopoulou
University of West Attica, Departement of Biomedical Sciences Faculty of Health Sciences, University of West Attica, Athens, Greece
Background: Robotic assisted adrenalectomy, is an alternative option to laparoscopic adrenalectomy, that offers the advantages of improved dexterity and visualization due to stereoscopic view, greater magnification and greater range of motion. Although there is still debate on the role of minimally invasive adrenalectomy in the treatment of malignant disease, there is ongoing interest on the role of minimally invasive surgery and especially robotic assisted adrenalectomy in the treatment of adrenocortical carcinoma.
Aims:This systematic review aimed to investigate the role of robotic assisted adrenalectomy in the treatment of adrenocortical carcinoma.
Methods: Electronic databases were searched with the search terms ‘adrenocortical carcinoma’, ‘’minimally invasive surgery’, ‘’robotic assisted surgery’, for the time period up to and including November 2020. Full publications, including clinical trials randomized or not, retrospective studies, case series, case reports that provided relevant data met inclusion criteria.
Results: Twenty five relevant manuscripts were identified and were obtained in full text. Experience on robotic assisted adrenalectomy for the treatment of adrenocortical carcinoma is still limited. There are case series and case reports of patients submitted successfully to robotic assisted adrenalectomy. There are limited data on long term follow up as well as on the long term oncological outcome. Given the rarity of the disease, randomized controlled trials comparing robotic assisted adrenalectomy with conventional adrenalectomy or with open surgery are difficult to be scheduled. The most important advantage of robotic assisted adrenalectomy in the case of adrenocortical carcinoma would be expected in the field of surgical stress response. Although, relevant data are scarce, based on the pathophysiology of surgical stress response, given that robotic assisted surgery enables an improved dexterity and visualization of the surgical field, surgical trauma is expected to be limited resulting In an attenuated surgical stress response. Attenuated stress response would be anticipated to lead to reduced post-operative morbidity and attenuated adverse effect on immunosuppression.
Conclusion: Robotic assisted adrenalectomy for the treatment of adrenocortical carcinoma is feasible, although experience is limited. Long term outcome data are limited. The most important advantage is anticipated through the induction of less surgical trauma and the subsequent mild stress response with favourable clinical outcome on post-operative complications and long term oncological outcome.
Robotics & new techniques—technology
P196—Laparoscopic bowel resection procedure with a combination of endoscopic marking and magnetic devices in pediatric surgery
Carlos Cadaval Gallardo1, D. Oliu1, M.M. Rodríguez Lima2, H. Bignon3, M. Martínez Ferro3
Badajoz Maternal and child Hospital, 1Pediatric Surgery, 2Pediatric Urgencies and Emergencies, Spain. 3Maternal and Child Hospitalary Fundation of Buenos Aires, Pediatric Surgery, Argentina
Aims: To report one of the first cases of magnetic-assisted laparoscopic intestinal resection in a pediatric patient, guided by previous endoscopic marking.
Methods: A 9-year-old patient with a history of Peutz-Jegher syndrome and several episodes of anemizing gastrointestinal bleeding.
The planification of the surgery was composed by two stages.
First stage: Endoscopy showing a jejunal polypoid lesion with an approximate diameter of 10 cm. Endoluminal marking of the lesion with chinese ink.
Second stage: We use laparoscopic minimally invasive surgery (MIS) two weeks after the first stage, the abdominal cavity was approached with three working ports: 12 mm umbilical, 10 mm on the right flank and 5 mm on the left flank. The marked region in the jejunum was perfectly visualized (Fig. 1) and, with the assistance of magnetic instruments (Fig. 2), an 8 cm intestinal resection was performed. Laterolateral anastomosis is then performed with a 35 mm endo-stapler and laparoscopic suture. Lesion was extracted by umbilical trocar.
Results: Satisfactory postoperative evolution. Pain controlled and onset of tolerance on the second day. Hospital discharge on the third day. Excellent aesthetic result. Pathological anatomy compatible with benign giant polypoid lesion.
Conclusions: MIS is proposed as the technique of choice in intestinal resections and anastomoses in pediatric surgery. We improve the technique with the use of presurgical endoscopic marking, which optimizes the anatomical location of endoluminal lesions, and assistance with magnetic instruments, which favors triangulation, improves traction-countertraction of the tissues and avoids the need of a fourth laparoscopic working port.

Robotics & new techniques—technology
P197—Development of the Ovipositor-Inspired Transport Mechanism for Minimally Invasive Surgery
Aimee Sakes
TUDelft, Biomechanical Engineering, The Netherlands
Aims: Aspiration-based tissue transport (suction) falls short as the trends of miniaturized instruments gain ground. As the ability of instruments to manoeuvre through the body necessitates an increase in length and decrease in diameter, the amount of suction needs to increase in order to provide the same transport functionality; which is currently at its limit. Additionally, aspiration-based transport mechanisms are prone to clogging, affect the surrounding healthy tissues, which might result in unwanted tissue damage, and, in an environment containing several types of liquid and tissues, indiscriminate tissue transport. As of today, there are no feasible alternatives for aspiration-based transport.
Methods: The developed biologically inspired mechanism of transport (patented) was designed to overcome sub-optimal transport behaviour that occur within aspiration-based transport, as well as provide a future-proof transport mechanism for transport through long and slender tubes. The proposed transport system is inspired by the egg-laying needle (ovipositor) of parasitic wasps. These wasps are able to deposit their eggs in a host or tree using a clever mechanism in which the wasp penetrates the substrate by moving the valves of the ovipositor in an alternating fashion. Our proposed prototype uses the same “friction-based transport” principle. The developed transport system consists of six axially reciprocating semi-circular blades actuated by a cam-mechanism (Fig. 1). As each blade accounts for approximately 1/6th of the total friction of the transported tissue mass, by moving the blades in a particular order, a friction differential can be created in the preferred transport direction. A proof-of-principle experiment was performed to investigate the effects of tissue elasticity, tissue heterogeneity, and motion sequence of the blades on the transport rate and reliability.
Results: It was found that the ovipositor-inspired transport mechanism was able to reliably transport pure and heterogenous gelatine tissue phantoms, as well as minced meat, with a transport speed of approximately 4.21 ± 0.74 mg/s.
Conclusions: As the trend for smaller, more flexible, and longer instrument continues, instruments like the one we developed are a necessity to fill the growing demand of minimally invasive surgeries in the near future.
Robotics & new techniques—technology
P198—Deep learning-based localization of the biliary tract in laparoscopic images acquired during surgical robotic procedures
Cristina Iacono1, Fanny Ficuciello1, M. Rese1, S. Sara2, A. Aldo3, E. De Momi4, U. Bracale5, F. Ficuciello1
1Università degli Studi di Napoli Federico II, Department of Electrical Engineering and Information Technology, 2Università Politecnica delle Marche, Department of Information Engineering, 3Università della Calabria, Department of Mathematics and Computer Science, 4Politecnico di Milano, Department of Electronics, Information and Bioengineering, 5Università di Napoli Federico II, Department of General Vascular and Thoracic Surgery, Italy
Aims: Laparoscopic cholecystectomy (LC) is one of the most frequently performed surgical procedures worldwide. The most serious complication is bile duct injury with an incidence in range 0.3–1.5%. To avoid bile duct injury, intraoperative visualization of the bile duct using near-infrared light and the fluorescent dye indocyanine green (ICG) were introduced during cholecystectomy. The problem in using ICG, is that, while enhancing the bile duct, it makes challenging to see all the other anatomical structures. The aim of this work is to implement a deep-learning algorithm for the localization of the biliary tract from white-light images acquired during the standard surgical practice.
Methods: To detect the biliary tract in real time, we used the You Only Look Once (YOLO), a state-of-the-art convolutional neural network. To train the network, we collected and annotated 12 white-light cholecystectomy video clips (for a total of 399 frames) from 12 different patients. The annotation was performed manually, by drawing a bounding box on the bile duct. The video frames were split to have 208 and 191 training and testing frames, respectively. The training set was used to train the neural network, while the test set was used for evaluation purpose only. The Intersection over Union (IoU) was used as evaluation metrics: IoU compares the annotated bounding boxes with the bounding boxes predicted by the network, as follows:
IoU = (Area of Overlap)/(Area of Union).
Results: Results are reported in Table 1, where the overall IoU is 0,65. The frames of patients 3, 6 and 12 were used only in the test set. The algorithm recognized the area of interest in 26 of 29 images in video 6 and in 14 of 19 images in video 12. The worst-case scenario happened in video 3 where only 6 of 39 images are correctly recognized.
Conclusions: This work proposes a deep learning approach to identify the biliary tract from white-light images acquired during the standard surgical practice, achieving a test average IoU of 0.65%.
Despite the small size of the dataset, we showed the potential of DL in the field and opening new perspectives for future research.

Robotics & new techniques—technology
P199—A review on the current applications of artificial intelligence in the operating room
Anne van Dalen, D.C. Birkhoff, M.P. Schijven
Amsterdam UMC, location AMC, University of Amsterdam, Surgery, The Netherlands
Aims: Artificial intelligence (AI) is an era upcoming in medicine and more recently, into the operating room (OR). Existing literature elaborates mainly on the future possibilities and expectations for AI in surgery. The aim of this study is to systematically provide an overview of the current actual AI applications used to support processes inside the OR.
Methods: Pubmed, Embase, Cochrane library, and IEEE Xplore were searched using inclusion criteria for relevant articles up to August 25th 2020. No study types were excluded beforehand. Articles describing all current AI applications for surgical purposes inside the OR were reviewed.
Results: Nine studies were included. An overview of the researched and described applications of AI in the OR is provided, including; procedure duration prediction, gesture recognition, intraoperative cancer detection, intraoperative video analysis, workflow recognition, an endoscopic guidance system, knot-tying, and automatic registration and tracking of the bone in orthopedic surgery. These technologies are compared to their, often more human-influenced, baseline alternatives.
Conclusions: Currently described applications of AI in the OR are limited to date. They may, however, have a promising future in improving surgical precision, reduce manpower, support intraoperative decision-making, and increase surgical safety. Nonetheless, the application and implementation of AI inside the OR still has several challenges to overcome. Clear regulatory, organizational, and clinical conditions are imperative for AI to redeem its promise. Future research on use of AI in the OR should therefore focus on clinical validation of AI applications, the legal and ethical considerations and on evaluation of implementation trajectory.
Robotics & new techniques—technology
P200—Indocyanine green fluorescence guided surgery (icg-fgs). 2 year experience in mexico citY
Ariel de Jesús Martínez Oñate
Private Practice, Surgery, Mexico
Aims: To present the 2 year experience in Mexico City with ICG-FGS in thyroid, parathyroid, epidermoid carcinoma of the base of the tongue, cholecystectomy, and benign and malignant pathology of the colon and rectum.
Methods: 28 laparoscopic cholecystectomies, 13 non acute, 15 with acute cholecystitis (AC), 4 by Single Port. 6 Colorectal procedures for benign and malignant pathology, 1 open, 5 laparoscopic or hand assisted. 8 procedures for benign and malignant pathology of the thyroid; and parathyroid resections for adenoma and hyperplasia. 1 squamous carcinoma of the base of the tongue. 1 varicocele. 44 procedures in 42 patients.
Results:
-ICG-FGS visualization was successfully achieved in 43 of the 45 procedures.
-In our first case ICG was administered within a too short span of time preoperatively and it was not useful for biliary visualization. In a squamous carcinoma of the base of the tongue we didn´t have the adequate telescope to see fluorescence.
-In 2 patients with two FGS procedures each one, the anatomic regions that were operated were different and 2 or 3 doses of ICG were administered.
-In cholecystectomy patients ICG-FGS was a very useful aid, particularly in AC. Even in very difficult cases (5) neithr intraoperative cholangiogram nor biliary intraoperative ultrasound were needed. No biliary duct injury was provoked.
-We found that the concept of “ excluded gallbladder “ is a feature with ICG-FGS.
-In Single Port Cholecystectomy ICG-FGS provided a more expedite and secure dissection of Calot´s Triangle.
-In thyroid and parathyroid cases there was a correlation between the number of parathyroid glands observed with good perfusion with ICG and the POP development of hypocalcemia.
-No protocol for sentinel lymphatic node in thyroid cancer could be established.
-In colorectal procedures ICG-FGS was an important aid for good anastomotic perfusion and lymphatic drainage.
-In one patient with a previous Jod-Basedow phenomenon ICG in a small dose was used without firing thyrotoxicosis.
-ICG was used safely in a patient with seafood allergy, but no iodine demonstrated allergy; we gave IV prophylactic pre-medication with an antihistaminic and a steroid.
Conclusion: ICG-FGS is a safe, reproducible and useful technique for the surgical procedures described in this paper.
Robotics & new techniques—technology
P201—A Realistic Liver Phantom for the Training and Quantitative Evaluation of Endoscopic Skills
Tian Qiu1, 2, Xiangzhou Tan1, X. Tan1, D. Kim2, D. Li3, M. Jeong2, D. Wichmann1, K Grund1, T. Qiu2
1University Hospital Tuebingen, Cyber Valley Research Group, Institute of Physical Chemistry, 2University of Stuttgart, Cyber Valley Research Group, Institute of Physical Chemistry, 3Max Planck Institute for Intelligent Systems, Micro Nano and Molecular Systems Lab, Germany
Aims: The training of minimally-invasive surgery requires realistic human-like organ phantom to simulate the surgical environment and provide timely feedback to surgeons. We develop a high-resolution soft liver model with the biliary system to facilitate the training and quantitative evaluation of transluminal procedures.
Methods: A three-dimensional (3D) digital liver model with dilated bile duct was reconstructed based on the magnetic resonance imaging (MRI) scans and medical knowledge. Negative molds were fabricated by 3D printing. Multiple polymeric materials, e.g. Ecoflex and hydrogels, were molded to mimic human liver tissues. Minimally-invasive procedures, such as direct peroral cholangioscopy (DPOC) and endoscopic ultrasound-guided transhepatic centesis (EUS-TC), were simulated in the phantom. New sensing technologies, e.g. artificial intelligence (AI)-based endoscopic image analysis and electronic impedance analysis through embedded electrodes, were used to quantitatively assess the surgical performance.
Results: The liver phantom is anatomically accurate, verified by multi-modality medical imaging, including computer tomography (CT), ultrasound imaging, and endoscopy. The images show the anatomic structures of the liver, especially the intrahepatic ducts, were accurately presented with down to ~ 1.7 mm resolution. The fabrication method herein is general, reproducible and cost-effective, which can be implemented to other organs. Minimally-invasive procedures were successfully performed in the liver phantom. The surgical accuracy was measured electronically and analyzed by AI algorithm, to provide quantitative feedback display to the trainees.
Conclusions: We present a high-fidelity liver organ phantom with tissue-like soft materials and the capability of quantitative assessment of surgical performance, which offers unique opportunity to provide useful feedback to surgeons to improve their surgical skills.
Robotics & new techniques—technology
P202—Performance of three-dimensional (3D) and ultra-high definition (4 k) technology in laparoscopic surgery: A systematic review and metanalysis
Hemanga Bhattacharjee1, Vitish Singla1, E. Gupta1, D. Singh1, D. Kumar2, A.Ashwani3
All India Institute of Medical Sciences, 1Surgical Disciplines, 2Anesthesiology, 3Biostatistics, India
Introduction: The technology in laparoscopic surgery is mainly focused to increase the quality of image and the depth perception in the form of ultra-high definition (4 K) and three-dimensional (3D) technology respectively. There is no level 1 evidence in favor of any of the technologies. A systematic review and metanalysis was performed to assess the performance of 3D vs 4 K technology.
Methods: A systematic search was performed independently by two authors across MEDLINE, Google Scholar, Embase using the PRISMA guidelines. All the randomised control trials comparing 3D and 4 K technologies were included irrespective of time of publication or sample size. Data for time taken, error rates, path length during instrument movement, work load and visual side effects was extracted. Metanalysis was conducted using random effects statistics.
Results: The search strategy revealed a total of 1835 articles, out of which seven studies were included. Six trials were conducted in a simulated setting and one in clinical setting. Time taken and error rates were reported in all the studies. Work load assessment and visual side effects were reported by 2 studies each. Three studies showed no superiority of 3D over 4 K, while the rest of the four did. Metanalysis for the time taken for peg transfer favoured 3D over 4 K (Overall effect: Z = 2.12; p = 0.03; Fig. 1). Forest plots for time taken for suturing (Z = 1.3; p = 0.19) and knot tying (Z = 1.7; p = 0.09) also favoured 3D over 4 K, results however being statistically insignificant. Path length was reported by two studies and was found to be lesser in the 3D group. Two studies measured the work load by NASA/Surg-TLX score. The load was lesser in the 3D group. However, the visual side effects were found to be higher in the 3D group as compared to the 4 K group.
Conclusion: 3D technology is likely to result in a shorter operative time and better efficiency of movement as compared to the 4 K technology by the virtue of its better depth perception. The incidence of visual side effects is higher in 3D as compared to 4 K. Further clinical rather than simulation studies shall be useful to strengthen this conclusion.
Solid organs—adrenal
P203—Intraoperative angiography with indocyanine green (ICG) in laparoscopic adrenal resection-Early experience
Maria Sotiropoulou, Stylianos Kapiris, N. Ntargakis, M. Psarologos, P. Metaxas, H. Kyzeridis, E. Kefalou, D. Stergiou, A. Paraskeva, E. Mavrodimitraki, M Kazantzi, P. Alexakou, A. Kolinioti, I. Alevizakis, S. Kapiris
"EVANGELISMOS" Hospital, 3rd Department of Surgery, Athens, Greece
Aim: The method of choice in adrenal surgery is laparoscopic adrenal resection nowdays, for both benign and malignant tumors, due to its important advantages. The recognition of the anatomy of the adrenal vessels and their variations is a key point of safe laparoscopic adrenalectomy. Indocyanine green (ICG), after intravenous administration, can be detected and visualized, using a special camera, allowing for the identification of the anatomical structures such as vessels and lymph nodes that contain the contrast. In the present study we will try to document the clinical utility of using ICG in laparoscopic adrenal resections.
Methods: Our study is a prospective controlled study. The study group consists of patients with adrenal disease who underwent laparoscopic adrenal resection. We administer 5 mg ICG intravenously before the adrenal dissection and we repeat the administration of 2.5 to 7.5 mg of ICG after the dissection of the gland.
Demographics and time of surgery have been recorded. Also, the intraoperative events, the possible transformations in open surgery were checked and we recorded whether the identification of the adrenal vein affected the duration of the surgery.
Results: 25 laparoscopic adrenal resections were performed using ICG, 15 left adrenalectomies and 9 right adrenalectomies. The duration of the surgery ranged from 120 to 160 min, with the left ones lasting longer than the right ones. In total, 7.5 to 12.5 mg ICG were administered and the clearest imaging of the vein was recorded in 60–70 s from administration. Regarding the imaging of vascular structures, in laparoscopic right adrenal resection, where the location of the adrenal vein is stable, the ICG did not seem to affect the finding of the structure but confirmed it in 2/3 cases while in the rest of the cases the vein was not recognized very clearly. The inferior vena cava was impressively highlighted helping to safely excise the adrenal gland. In contrast, in the left laparoscopic adrenalectomy, where the recognition of the vein is, in our opinion, more difficult, the ICG helped us identify the vessel in 75% of cases before the dissection of the Gerota fascia and in 100% of the cases after the dissection, resulting in a significant reduction of the operative time.
Conclusion: ICG in laparoscopic adrenal resection seems to be a useful tool with low cost, wide range of administration and without special requirements in its use or side effects. On right laparoscopic adrenalectomy ICG can help us confirm the anatomy and perform safe resection. On the left, where the greatest difficulty is encountered, it seems to be able to direct the dissection by reducing the intraoperative time, the complications and of course the morbidity.
Although the results are early, they are quite encouraging, especially in the localization of the left adrenal vein.
Solid organs—adrenal
P204—Adrenal sparing surgery and primary macronodular bilateral adrenal hyperplasia
Eugenia Yiannakopoulou
University of West Attica, Departement of Biomedical Sciences Faculty of Health Sciences, University of West Attica, Athens, Greece
Background: Primary macronodular adrenal hyperplasia is a rare cause of Cushing Syndrome. Patients present with bilateral adrenal tumors and variable cortisol production. The clinical spectrum of presentation ranges from mild hypercortisolism to overt Cushing Syndrome. Less commonly there is also excess aldosterone and/or oestrogen/androgen secretion. Bilateral macronodules (> 1 cm) with intraglandular hyperplasia or atrophy are commonly found. Treatment of primary macronodular bilateral adrenal hyperplasia is challenging. Treatment options include medical management and adrenal surgery. Bilateral adrenalectomy was the standard treatment for patients with bilateral adrenal involvement and Cushing syndrome. However, bilateral adrenalectomy leads to definitive adrenal insufficiency. Recently, there is ongoing interest on the role of adrenal sparing surgery in the treatment of the disease.
Objective: This manuscript aimed to systematically review data on the role of adrenal sparing surgery in the treatment of patients with primary macronodular adrenal hyperplasia.
Methods: Pubmed, Scopus, Google Scholar, Science Citation Index were searched with the search terms “primary macronodular bilateral adrenal hyperplasia”, “unilateral adrenalectomy”, “partial adrenalectomy”, “adrenal sparing surgery”. The search covered the period up to and including November 2020. Full publications that presented data on the efficacy and safety of adrenal sparing surgery in patients with macronodular bilateral adrenal hyperplasia met inclusion criteria. Both unilateral adrenalectomy and unilateral adrenalectomy combined with partial adrenalectomy of the contralateral gland were evaluated.
Results: Sixty five studies met inclusion criteria and were obtained in full text. The majority of the manuscripts included retrospective studies, case series and case reports. The number of patients included in the studies is rather small and control group is commonly lacking. Unilateral adrenalectomy of the larger gland has been reported with disease remission in a significant number of patients. More specifically, unilateral adrenalectomy leads to normalization of urinary free cortisol in 92%-100% of patients and even corticotropin insufficiency in 40–60% of patients. Therefore,, long term follow up is needed. Unilateral adrenalectomy with partial adrenalectomy of the contra-lateral gland has also been reported,, leading to clinical an biochemical cure. The volume of the remnant adrenal gland is crucial for the outcome, given that adrenal glands affected by the disease are characterized by hypo-steroidogenesis. CT volumetric estimation of the adrenal gland has been recently suggested as an adjunct in the adrenal sparing surgical decision.
Conclusion: Although data are still limited, adrenal sparing surgery should be always considered in the management of patients with macronodular bilateral adrenal hyperplasia. The obvious advantage is the possible avoidance of definitive adrenal insufficiency. Long term follow up is needed.
Solid organs—adrenal
P205—Open and laparoscopic surgery for isolated adrenal metastases
Chrysanthi Aggeli, C. Parianos, K. Pateas, V. Theocharidis, D. Stratigakos, A .Katseli, G.N. Zografos
General Hospital of Athens "G.Gennimatas", 3rd surgical department, Greece
Objective: Laparoscopic adrenalectomy has rapidly replaced open adrenalectomy as the procedure of choice for benign adrenal tumors. Laparoscopic adrenalectomy for malignant tumors has been adopted more reluctantly because of concerns over completeness of resection and the risk of residual disease, recurrence or port site metastases. The aim of this study was to evaluate the short and long-term results of laparoscopic and open surgery for isolated adrenal metastases, performed in a single surgical unit.
Material and methods: A retrospective analysis of patients with isolated adrenal metastases was conducted. From May 1997 to September 2020, 832 adrenalectomies were performed on 816 patients.All patients were investigated and operated on using an established departmental protocol. Relevant data were retrieved from the hospital records of those patients who underwent adrenalectomy. Preoperative localization was established in all patients by computed tomography (CT), magnetic resonance (MRI) or positron emission tomography (PET) scan. Forty—four patients underwent adrenalectomy for isolated adrenal metastasis. There were 33 men and 11 women, aged from 48 to 79 years (mean age 63.4 years). Of these, 11 were synchronous and 33 metachronous. A metachronous metastasis was defined as adrenal metastasis appearing at least 6 months after the initial diagnosis. Primary tumors included mainly lung cancer (n:18 patients) and renal cell carcinoma (n:16) and rarely colon cancer (n:2), gastric cancer(n:1), melanoma(n:1), breast cancer (n:1), sarcoma Ewing (n:1), urinary bladder (n:1), non Hodgkin lymphoma (n:1), endometrial cancer(n:1) and synovial cancer (n:1). The size of the tumor was larger than 7 cm in 26 from the 44 tumors.
Results: Laparoscopic surgery underwent 17 patients whereas open approach 17 patients. In 10 cases the operation was started laparoscopically and was converted to open for oncological reasons. All the operations, open or laparoscopic, were performed with the patient in the lateral decubitus position. Therefore, there was no need to change the position of the patient in the event of a conversion to an open operation. A transperitoneal lateral approach was used to perform laparoscopic adrenalectomy.(picture 1) The adrenal gland was never grasped in order to avoid troublesome bleeding or tumor disruption. Αdditional ports have been used when there was a special need. Six patients with adrenal metastases necessitated en bloc resections of other organs (kidney, tail of the pancreas, spleen) by open approach. (picture 2) The average postoperative hospital stay for laparoscopic adrenalectomy ranged from 1 to 3 days and 5 to 20 days for patients who underwent open or converted procedures. There was no perioperative mortality. The survival rate was 76% the first 12 months postoperatively, 56.6% in 24 months and 25% in 5 years. No patients presented with local tumor relapse or port-site metastases.
Conclusions: Laparoscopic adrenalectomy is the treatment of choice for most metastatic adrenal tumors. En bloc resection of adjacent organs should be done by open approach from the start.
References:
1.C.T.Bradley,V.E.Strong Surgical management of adrenal metsatases Journal of Surgical Oncology 2014.
2.G.N.Zografos et al. Surgical treatment of potentially primary malignant adrenal tumors:an unresolved issue. Hormones 2015
3.M.Puccini et al. The role of laparoscopic resection of metastases to adrenal glands. Gland Surg 2017.


Solid organs—adrenal
P331—Type of anesthesia is independently associated with intraoperative hemodynamic instability during minimally invasive adrenalectomy for pheochromocytoma
Won Woong Kim1, D.H. Kim2, J.W. Cho1, C.S. Rah4, Y.M. Lee1, K.W. Chung1, J.M. Koh3, S.H. Lee3, S.J. Hong4, Y.J. Kim2, T.Y. Sung1
Asan Medical Center, University of Ulsan College of Medicine, 1Department of Surgery, 2Department of Anesthesiology and Pain Medicine, 3Division of Endocrinology and Metabolism, 4UiJeongbu Eulji medical Center, Department of Surgery, Korea
Background: Pheochromocytoma often presents perioperative hemodynamic instability (HDI). This study was conducted to evaluate the risk factors causing intraoperative HDI during minimally invasive posterior retroperitoneal adrenalectomy (PRA) for pheochromocytoma.
Materials and Methods: This is a retrospective study analyzing prospectively collected data of 172 patients who underwent laparoscopic PRA or robotic PRA for pheochromocytoma between January 2014 and December 2020 at single tertiary center. Patients were divided into two groups according to intraoperative hypertensive event of systolic blood pressure (SBP) > 160 mmHg. Clinical manifestations and perioperative hemodynamic conditions were analysed.
Results: In multivariate logistic regression analysis, tumor size > 3.4 cm{OR = 3.14, 95% CI (1.48 ~ 6.64), p = 0.003}, type of preoperative alpha-blocker (selective type) {OR = 3.9, 95% CI (1.52 ~ 10.02), p = 0.005}, preoperative use of beta-blocker {OR = 3.94, 95% CI(1.07 ~ 14.49), p = 0.039}, and type of anesthesia (total intravenous anesthesia (TIVA) vs. balanced anesthesia){OR = 2.57, 95% CI(1.23 ~ 5.38), p = 0.012} were determined as independent risk factors for intraoperative hypertensive event during minimally invasive adrenalectomy.
Conclusion: Type of anesthesia was independently associated with intraoperative HDI along with larger tumor size, type of preoperative alpha-blocker and use of preoperative beta-blocker. TIVA increased the intraoperative hypertensive event compared to balanced anesthesia (BA). Thus, consideration of type of anesthesia prior to adrenal surgery for pheochromocytoma along with use of preoperative non-selective alpha-blocker may be beneficial to minimize the risk of intraoperative HDI.

Solid organs—adrenal
P335—Laparoscopic adrenalectomy for large adrenal tumor guided by a 3d anatomic model. New frontiers in abdominal surgery
Alessio Giordano1, 2, G.I. Di Filippo1, F.I. Feroci1, M.A. Baraghini1, R.O. Giudicissi1, A.L. Garzi1, V.I. Mirasolo1, LU Romoli1, R.I. Sacchetti1, S.A. Vellei1, TI Zalla1, F.R. Cammelli1, F.R. Moroni1, T.O. Guagni1, N.I. Niccolò1, S.T. Cantafio1
1General Surgery Unit/ Nuovo Ospedale "S. Stefano", Prato, 2Department of Surgery, Azienda ASL Toscana Centro, Italy
If until a few years ago the surgeon could study a complex surgery to be performed only on the basis of two-dimensional black and white images produced by Rx and subsequently by CT and MRI, today, thanks to continuous advances in research and technology, can have 3D physical models on a scale of 1 to 1 of an organ or specific anatomical structures for the purpose of adequate planning of the surgical intervention. This allows you to choose the best surgical strategy and avoid any intraoperative complications, thus improving the patient's postoperative outcome. This technology is now used in neurosurgery, cardiac surgery, liver and pancreatic surgery, but few data are available in the literature in the field of adrenal surgery. One of the fields of application of this methodology can be represented by the treatment of adrenal tumors and in particular of large adrenal tumors. The literature defines tumor larger than 6 cm as giant adrenal tumors. These are rare neoplasms associated with malignancy in 25% of cases. The size of the adrenal tumor has always been at the center of discussion in the literature given the greater probability of malignancy of the lesion and the possible technical limitations of laparoscopy in the presence of very large masses. These limits could be overcome through 3D reconstructions for the purpose of adequate operative plaining.
We report the case of a 53-year-old woman (BMI 35 kg / mm2) with a blood chemistry and clinical diagnosis of Cushing's syndrome. The abdominal CT showed a right adrenal lesion of about 7 cm with an adenomatous appearance. To better define the relationship between the neoplasm and the inferior vena cava, the vascularization of the adrenal gland with any anatomical anomalies and the specific location of the middle adrenal vein, a 3D printed model was created in 1: 1 size based on the preoperative CT.
A right laparoscopic adrenalectomy with a lateral transperitoneal approach was performed. As confirmed by the 3D reconstruction, the main adrenal vein had a particularly short course compared to the vena cava and this allowed its adequate dissection without causing any iatrogenic lesions. There were no vascular anatomical anomalies and the postoperative course was regular.
Our clinical case highlights the feasibility, usefulness and clinical effectiveness of 3D anatomical models for correct preoperative planning, the surgeon's intraoperative guidance to reduce possible errors and therefore improve the patient's postoperative outcome. The size of adrenal neoplasms is still at the center of debate but it is only a predictive parameter of malignancy of the tumor. The laparoscopic approach is a safe and feasible method in terms of surgical and oncological outcomes even for large adrenal tumors, if performed in expert hands and in high-volume centers. The presence of vascular infiltration or adjacent organs is a contraindication to the laparoscopic approach. The 3D models can help the surgeon in case of large lesions or in the presence of malignant neoplasms with infiltration of adjacent organs to define the best surgical strategy but also as a guide in cases of partial adrenalectomy.
Solid organs—gynaecology
P206—Acute abdomen in pediatrics: bilateral piosalpinx. A serious complication after conservative treatment of apendicular plastron. Laparoscopic approach
Carlos Cadaval Gallardo1, M.M. Rodríguez Lima2, I. Ibarra Rodríguez1, A.E. Hernández Calvarro3, R.M. Romero Ruiz3
Badajoz Maternal and child Hospital, 1Pediatric Surgery, 2Pediatric Urgencies and Emergencies, 3Virgen del Rocío Children´s Hospital, Pediatric Surgery, Spain
Aims: To present the clinical case of a patient who, after being treated conservatively with the diagnosis of appendicular plastron, is referred two years later due to a pelvic inflammatory condition associated with bilateral pyosalpinx.
An exploratory laparoscopy was required, showing a very serious complication as a finding, which will be described below.
Methods: Clinical case. 13-year-old patient with a personal history of appendicular inflammatory plastron managed conservatively at end of 10 years of age, without undergoing an appendectomy.
She was referred for pain in IDF and fever of several days of evolution. Ultrasound shows a pelvic inflammatory process compatible with bilateral piosalpinx, which is confirmed on abdominopelvic CT. (Fig. 1).
After multidisciplinary evaluation with gynecology, we decide a conservative management, with intravenous antibiotic therapy for pelvic inflammatory disease and close clinical-radiological follow-up. However, the radiological follow-up showed a persistence of the bilateral pyosalpinx findings, and absence of total clinical improvement so it was decided to perform an exploratory laparoscopy with 3 trocars (12–5-5 mm). And posterior addition of a fourth accessory trocar (5 mm).
Results: Laparoscopy demonstrated the presence of an inflammatory plastron in the RIF, encompassing the appendicular tip (proximal third with a healthy aspect) and the right uterine tube (Fig. 2). Appendectomy and a bilateral salpingostomy were performed with non-purulent material outlet.
Successful evolution after the intervention. No microorganisms were isolated in the samples. The pathology report describes xanthogranulomatous appendicitis, a very rare entity and generally associated with subacute / chronic inflammation of the appendix.
Conclusions: The failure to perform deferred appendectomy in the patient led to reactivation of the process years later, with a serious associated gynecological complication.
The risk of performing a delayed appendectomy, with a low rate of complications described in the current literature, is justified by the benefit of avoiding reactivation of the disease, which presents as a complicated condition in many cases.
Thus, it is necessary to avoid misdiagnoses that go unnoticed (complicated Meckel, appendicular malformation, even malignant appendicular tumor, among others).

Solid organs—kidney
P207—Laparoscopic nephrectomy for living kidney donor with prior laparotomy
Vasileios Drakopoulos, N. Roukounakis, S. Voulgaris, M. Christou, V. Vougas
Evangelismos General Hospital, 1st Dep. of Surgery and Transplant Unit, Greece
Background: Laparoscopic nephrectomy for renal transplantation has become a standard operation worldwide since it provides faster recovery and return to the donor’s everyday activities.
Method: We present a case of a 68-year-old male, living kidney donor, who had undergone exploratory laparotomy following a car accident one year before laparoscopic nephrectomy. The patient was placed in the typical left decubitus position for nephrectomy. Two 5 mm trocars, and a 10 mm one were placed to the left midclavicular line, between the costal cartilage and the anterior superior iliac spine, in order to achieve triangulation. A 10 mm trocar was placed suprapubically and was replaced by a gel-port for the graft’s removal. Laparoscopic nephrectomy was performed, following symphysiolysis. Operative time was three hours. Time of warm ischemia was three minutes.
Results: The recipient presented immediate diuresis. The donor had an uneventful recovery and was discharged four days later.
Conclusions: Laparoscopic approach seems to be safe for live kidney donors, even in cases of prior laparotomy. It is related to less pain, fewer complications and shorter hospitalization. The time of warm ischemia does not seem to affect the graft’s function. The donor returned to his everyday activity six days post-operatively.
Solid organs—kidney
P208—Improving patient information following vascular access procedures
Tarik Jichi, S.X. Khan, J. Virik, K. Gregory
North bristol Trust, renal transplant, United Kingdom
Background: Obtaining vascular access is critical in treatment of end stage renal failure, allowing haemodialysis to take place. Vascular access procedures are often day case procedures, so to ensure optimal post-operative outcomes it is vital patients are provided with adequate information, complications to be aware of and who to contact for advice once discharged.
Methods: Patient feedback forms were used to gather information on the perceived clarity of information provided, ease of access of this information for further advice if required. A patient information leaflet, containing information about the procedure, post-operative care and contact information was then designed and administered to patients when they attended for their vascular access appointment. The results of the feedback forms were compared pre and post intervention.
Results: Data was collected from a period of 14 days of vascular access procedures (totalling 7 patients pre-intervention and 5 post intervention). Post intervention results showed an improvement in patient satisfaction regarding the information provided; with 80% knowing where to access further information, an improvement from 40% pre intervention, satisfaction regarding the quality of information provided increased to an average of 9.5/10, and 100% of patients reported knowing who to contact for further information, compared to 70% pre-intervention.
Conclusions: Providing clear and concise information to patients undergoing any procedure improves patient understanding of the procedure, increases confidence in where to access further information or advice, and increases overall patient satisfaction. Therefore, it is best practice to ensure vascular access patients are provided with relevant information in the form of patient information leaflet.
Solid organs—kidney
P209—Is laparoscopic technique suitable for initial experience in live donor nephrectomy ? Results of the first 50 cases
Emrah Akin1, N. Firat1, T. Demirci2, K. Gündoğdu4, E. Baş1, B. Kamburoğlu1, H Dheir3, F. Altintoprak1
Sakarya University Medical Faculty, 1General Surgery, 2Endocrinology, 3Nephrology, 4Çerkezköy Devlet Hastanesi, General Surgery, Turkey
Aim: Laparoscopic donor nephrectomy is one of the advanced laparoscopic surgical procedures and also the most preferred method for live donor nephrectomies. In this manuscript, we evaluate the results of the first 51 laparoscopic live donor nephrectomy cases of a surgical team without experience of open donor nephrectomy.
Material-Method: The medical records of laparoscopic donor nephrectomy surgeries between April 2019 and August 2020 were retrospectively reviewed. Demographic and routine pre-transplantation data, donor nephrectomy side selection and reasons, surgical technique details, duration of warm ischemia, operation and hospitalization, postoperative laboratory parameters with early morbidity results were evaluated in detail.
Results: Results of 51 donors between the specified dates were evaluated. The mean age of the patients was 44.6 ± 11.6 (22–69). The patients' F / M ratio was 25/26. The number of patients with BMI⩾30 was 14 (27.4%). Right nephrectomy was performed to ten donors (19.6%). The mean operative time of the patients was 130 min (120–160) and the mean warm ischemia duration was 149 s (113–180). Postoperative complications were seen in 4 patients (7.8%).
Conclusion: We think that the laparoscopic method for live donor nephrectomy can be applied from the initial stage safely by teams that have advanced laparoscopic surgery experience.
Key words: Transabdominal; laparoscopic nephrectomy; donor nephrectomy; live donor nephrectomy.

Solid organs—spleen
P210—Experience with the use of single-port approach in a massive infarcted wandering spleen
Carlos Cadaval Gallardo1, M.M. Rodríguez Lima2, G. Gavilanes Salazar1, C. Mojica Salamanca3, M.J. Moya Jiménez3, J. Morcillo Azcarate3
Badajoz Maternal and child Hospital, 1Pediatric Surgery, 2Pediatric Urgencies and Emergencies, 3Virgen del Rocío Children´s Hospital, Pediatric Surgery, Spain
Aims: To present a clinical case and explanatory poster of the intervention of a patient with a diagnosis of a wandering, twisted and infarcted spleen in which we decided to make a laparoscopic splenectomy using a single-port approach.
Methods: Case report. 14-year-old patient with VACTERL sequence PA, operated on for Tetralogy of Fallot, antiaggregated due to being a carrier of a pulmonary valve and stent, with left renal agenesis and severe dorsolumbar scoliosis.
She presented to Virgen del Rocío Children's Hospital with abdominal pain of 10 days of evolution, being evaluated in the emergency room on several previous occasions. After palpation of the abdominal mass, an ultrasound scan was performed with a finding of doubtful splenic infarction, later confirmed on CT, with an image of a twisted pedicle and massive splenic infarction.
Given the clinical stability, absence of alarm signs and controlled pain, a preferential schedule for laparoscopy and splenectomy was decided. Antibiotic therapy was started and Preventive Medicine was contacted.
The procedure was realized with 3 laparoscopic ports. Initial umbilical single-port with 3 trocars and during the surgery (Fig. 1), the addition of two 5 mm accessory trocars was necessary for conclude the procedure.
Results: A wandering heterotopic spleen is found in the lesser cavity, between the colon and the stomach, with a twisted pedicle and massive infarction (Fig. 2). We performed splenectomy and extraction by umbilical incision. There are two accessory spleens that were respected. Favorable evolution with onset tolerance the next day and discharge at fourth day.
Conclusions: Laparoscopy is the technique of choice in splenectomy in pediatric surgery, even when there is existence of a difficult or special anatomy, like in our case. The benefit of using a single-port approach in this case is described, despite the need of additional trocars for the completion of the procedure.

Solid organs—spleen
P211—Study of ergonomics in terms of angle of manipulation and angle of azimuth in laparoscopic splenectomy
Amrutha Varshini, G. Joshi, Y.S. Rathore
All India Institute of Medical Sciences, New Delhi, Surgical Disciplines, India
Aim: To study the ergonomics in laparoscopic splenectomy.
Objectives: To study the ergonomics in terms of.
i.Angle of manipulation.
ii.Angle of azimuth.
Materials and Methods: After approval of institute ethics committee and informed consent from patients, a total of 12 cases requiring splenectomy were prospectively evaluated. Patients who do not give consent, age less than 15 years and marked splenomegaly (more than 20 cm) were excluded from the study.
It is an observational study where angle of manipulation between right and left working port of surgeon and angle of azimuth of both working instruments with the camera were measured intraoperatively in laparoscopic splenectomies.
Results: In this series of twelve patients of laparoscopic splenectomy in lateral position, angle of manipulation ranged from 41 to 85 degrees. The Azimuth angle between first working port(epigastric) and camera port was in the range of 22–45 degrees and the Azimuth angle between camera port and second working port was in the range of 19–40 degrees.
Conclusion: This is the first study, where measurement of angle of manipulation and angle of azimuth have been attempted while performing laparoscopic splenectomy. It is feasible and safe to measure these angles. In right semi lateral position optimum working angles for instruments may be achieved in most of the patients. Principles of triangulation of port placement holds good in this position. But one size fits all does not apply to the practice of surgery. This study gives valuable insight into the application of theoretical concept of triangulation in port placement. When we perform these measurements on a larger sample size it will help us to modify the port position to gain advantages of better ergonomics. This may help surgeons for better long term health.
Solid organs—spleen
P213—From suspicious liver mass to splenosis: a case report
Francisco Marrana1, C. Tavares2, C. Quintela1, P. Valente1, L. Barbosa1, R. Peixoto1, G Faria1
Unidade Local de Saúde de Matosinhos, 1General Surgery, 2Radiology, Portugal
Splenosis is defined as the rare case of heterotopic autoimplantation of splenic tissue in the abdominopelvic or thoracic cavities being reported in several patients with history of trauma to or surgery of the spleen. Intrahepatic splenosis occurs less frequently and the pathophysiology can be explainded by a “seeding” of splenic pulp fragments in the liver being caused by splenic trauma. Alternatively, a hematogenous spread of cells trough the splenic veins could result in hepatic splenosis. It usually presents as an asymptomatic mass incidentally discovered. The lack of typical radiological features makes its’ diagnose challenging with non-invasive means and difficult to distinguish from other hepatic masses, such as adenoma or hepatocellular carcinoma. This case report aims to resume this kind of challenge.
A 51-year-old man was referred for further evaluation of a solid liver lesion, well circumscribed, homogeneous, and suggestive of focal nodular hyperplasia, discovered incidentally during routine abdominal ultrasound. He didn’t present symptoms and there were no palpable masses at physical examination.
His medical history included hepatitis B, systemic arterial hypertension, dyslipidemia, nephrolithiasis and an urgent splenectomy due to traumatic rupture 10 years before.
Blood analysis showed mild elevation of liver transaminases with no associated cholestasis. Immunology serology and microbiology discarded the presence of acute hepatitis B.
For better characterization of the hepatic lesion, the patient underwent an abdominal magnetic resonance imaging that showed two nodular lesions in segments II & III. Both had hyperenhancement in the arterial phase and wash-out in the late phases which, suggestive of β-catenin mutated adenoma, worrisome for the risk of malignant transformation of this kind of adenomas. Therefore, after clinical evaluation of operative risk, surgical intervention was proposed.
An exploratory laparoscopy was performed and both lesions were enucleated with clear margin from the liver. There were no postoperative complications and the patient was discharged in the following morning. Histopathology revealed intrahepatic heterotopic splenic parenchyma, with no evidence of neoplasia in either lesions.
Through this report, we emphasize the importance of considering intrahepatic splenosis as a possibility in patients with hepatic nodules and history of splenectomy, particularly when its’ presentation is near the live capsule.

Solid organs—spleen
P215—Spleen Sarcoma associated with the Epstein-Barr virus: a rare splenic tumor
Rui Mendes Costa, T. Fonseca, L. Graça, E. Barbosa
Centro Hospitalar Universitário de São João—Porto, Serviço de Cirurgia Geral, Portugal
Clinical case: A 67-year-old female patient was referred to a General Surgery consultation for a splenic lesion identified on ultrasound. Abdominal CT shows a 6 cm nodule, with heterogeneous uptake, which may correspond to an hemangioma. To better clarify the etiology of the lesion, the patient underwent MRI, confirming the 6 cm nodular lesion, with areas of T2 hyposignal, showing progressive contrast uptake, with a central scar-like area, suggesting the possibility of corresponding to a lesion of sclerosing angiomatoid nodular transformation (SANT).
The patient underwent laparoscopic splenectomy, the surgical procedure and the postoperative hospitalization went uneventfully. Histological examination revealed an expansive growth neoplasm, with well-defined limits, compatible with fibroblastic dendritic follicular cell sarcoma, inflammatory-like pseudotumor.
Comment: Splenic inflammatory pseudotumours are rare lesions, often associated with the Epstein Barr virus. These tumors are generally of good behaviour and have a good prognosis. Total splenectomy is the gold-standard treatment, with no need for adjuvant therapy. The recurrence of this type of tumors is exceptionally rare.

Solid organs—spleen
P216—Splenic Infarcts and Splenectomy: 5 Years of Surgical Experience
Yashwant Singh Rathore, S. CHUMBER, A. Chaturvadi
All India Institute of Medical Sciences, New Delhi, Department of Surgical Disciplines, India
Splenic infarction is encountered rarely in clinical practice. The wide spectrum of clinical presentation makes its diagnosis elusive. It usually responds to conservative management but rarely surgical intervention is needed if it is refractory symptoms or secondary complication. We present our experience of splenectomy performed for splenic infarct which failed to respond to medical management over the last 5 years from 2015 to 2019.We performed 9 splenectomies (7 laparoscopic and 2 open). Most of these patients were young females (66.7%, 6/9). Mean age of patients in our series was 31.1 years (± 15.8 years). Fever (77.8%) and abdominal pain (66.7%) were the most common presenting symptoms. Diagnosis was made on the basis of contrast enhanced.
CT scan of abdomen. Infective endocarditis (33.3%, 3/9) was the most common underlying aetiology. All of these patients initially received a trial of conservative management for a median duration of 19 days. Post-operative course was uneventful for most of these patients with a resolution of symptoms in post operative period. There were two patients who developed surgical site infection and one who developed subdiaphragmatic collection which was drained percutaneously via a pigtail insertion. Patients were discharged after a median duration of 4 days after surgery and referred for post-splenectomy vaccination in haematology clinic. There is scarcity of literature on role of surgical intervention in symptomatic splenic infarct refractory to conservative management. How long should these patients be managed before considering them for splenectomy is a question worth exploring.
Solid organs—thyroid
P219—Principles of creation of safe working space in endoscopic thyroid surgery
Igor Kurganov, Dmitry Bogdanov, I.A. Kurganov, M.Sh. Mamistvalov, S.I. Emelyanov, D.Yu. Bogdanov
A.I. Yevdokimov Moscow State University of Medicine and Dentistry, Chair of Endoscopic Surgery, Russia
Aim of the study: To work out the principles of formation of safe working space (SWC) in endoscopic thyroid surgery (ETS).
Materials and methods: The results of endoscopic thyroid surgeries via extracervical approaches were investigated. 15 experimental surgeries were hemithyroidectomies through transaxillary (5 cases), axillo-breast (5) and axillo-retroauricular approaches (5) approaches with gas insufflation. 17 hemithyroidectomies were performed for benign thyroid nodules with gasless transaxillary endoscopic approach. 3 were male (17,6%), 14 were female patients (82,4%). Size of the nodule was 4,4 ± 1,3 cm on average and thyroid volume was 55,1 ± 11,3 ml.
Results: Experimental part of the study included assessment of capability for parathyroid and recurrent laryngeal nerve (RLN) identification and preservation. Visualization and permanence of both parathyroid glands on the site of surgery was achieved in 100% of cases. RLN was identified in 3 of 5 surgeries via transaxillary approach, 4 of 5 axillo-breast and axillo-retroauricular approaches. 100% rate of preservation of RLN was proved during open anatomic dissection. In clinical part of investigation identification of both parathyroids was successful in 94,1% of cases, RLN – in 76,5% of patients. Complications related to postoperative hypocalcemia and disorders of vocal cords mobility did not occur. Complications included skin perforation in the clavicular area (5,9%) and short-term brachial plexitis (35,3%). We developed a number of principles enabling creation of SWC in performing endoscopic thyroid surgery, including transaxillary access: accurate localization of trocars placement sites or skin incision; creation of working space of adequate width and volume; correct direction of tissue dissection during tunnel formation to the thyroid; maintenance of low gas pressure during insufflation; proper choice of length and width of the retractor blade in surgeries without gas insufflation; consideration of large neck vessels projection during insertion of trocars and tissue dissection; meticulous mobilization of muscular structures for bleeding prevention; assurance of fully mobility of the thyroid lobe before initiation of identification of RLN and parathyroids; adherence to distance to vital anatomic structures while using electrosurgical instruments to avoid thermal injury.
Conclusion: Adherence to the aforementioned principles of creation of SWC enables to facilitate high level of technical safety of ETS.
Upper GI—benign esophageal disorders
P220—Deliberate Foreign Body Ingestion (DFBI) amongst adults: associations between type and number of items ingested with endoscopic and surgical outcomes
Maria-Kassandra Coronel1, P.I. Domingo2, S.L. Lee1, M.R. Alenton1, M. Zaidi3
1University of Santo Tomas, Faculty of Medicine and Surgery, 2University of the East Ramon Magsaysay Memorial Medical Center, Medicine, Philippines. 3Dow University of Health Sciences, Medicine, Pakistan
Background: DFBI is a rare, medical emergency. This study investigates DFBI amongst an adult population, the type of foreign body intentionally ingested, the success of endoscopic retrieval of said foreign body (FB), the number of surgeries required should endoscopic retrieval of FB be unsuccessful, and their associations.
Methods: A thorough review was performed using electronic databases (Pubmed/Medline, Google Scholar, Cochrane library, Scopus) to identify relevant peer-reviewed articles from 2010 until November 5, 2020. Case reports written in English that reported endoscopic findings of intentional FBI amongst adults (≥ 18 years) were included. Articles that did not specifically mention number and type of items deliberately ingested were excluded. Continuous data, frequencies and percentages for dichotomous variables are summarized using descriptive statistics such as mean and standard deviation. Odds ratios (OR) were used for the association between number of objects each patient ingested and success of endoscopic item retrieval. Regression analysis was used for the association between type of objective ingested and number of surgeries performed, post-endoscopic failure.
Results: Seventy-one cases were included. The patients had an average age of 38 years, and were mostly male (M:F 1.45:1). All cases of large wood items and all cases of ingested batteries, regardless of number ingested, had successful endoscopic retrieval of items. Comparatively, all cases of ingested gloves, regardless of number ingested, had unsuccessful endoscopy. This study also found that intentional ingestion of a greater number of large paper items, large metal items, pens, glass, hair, and lighters is each associated with unsuccessful endoscopy. All unsuccessful endoscopic retrievals required surgery. Fewer surgeries were performed if object ingested large wood [Regression Coefficient (RC): -0.63], large metal [RC: -0.20], pens [RC: -0.13], glass [RC: -0.13], pack of illicit drugs [RC: -0.30], or a lighter [RC: -0.64]. More surgeries were performed if object ingested was a glove [RC: 2.45, p-value: 0.002].
Conclusion: In intentional FBI cases, clinicians should have heightened suspicion amongst patients with specific types of items ingested. While endoscopy should be employed early in management for diagnostic and therapeutic means, clinicians should also be mindful of the potential need for surgery should endoscopic retrieval fail.
Upper GI—benign esophageal disorders
P221—Efficiency of laparoscopic antireflux surgery after non-responding long-term medical treatment in GERD patients
Zsolt Simonka, A. Paszt, S.Z. Abraham, I. Toth, Z. Horvath, J. Tajti, J. Pieler, K. Kovach, A. Lepran, A. Rosztoczy1, T. Wittmann1, G.Y. Lazar
University of Szeged, Department of Surgery, 1Department of Internal Medicine, Hungary
Aims: Gastroesophageal reflux disease (GERD) is one of the most common upper gastrointestinal diseases in western countries. Good response of medical treatment in patients with GERD is a No1 indication for laparoscopic antireflux surgery (LARS). Failure of long-term medical treatment as an indication for LARS is questionable due to the heterogeneity of these patients. In order to identify the potential benefit of surgical treatment we compared the group of responder and non-responder GERD patients in our retrospective clinical study.
Methods: Between 2001 and 2008 we performed laparoscopic Nissen fundoplication in 254 cases of GERD. In the responder Group I (Gr.I) (61 pts) the length of medical treatment was 4.16 ± 1.54 months. In the non-responder group II (Gr.II) (193 pts) the length of medical treatment was longer: 25.86 ± 17.15 months. There were no differences in the average age of the patients (54.9 vs 55.6 year, p = 0.495), and the BMI was also similar in both groups (26.7 vs 27.3, p = 0.451). We confirmed longer symptomatic period in Gr.II (19.7 vs 69.0 months, p = 0.013). After the LARS the patients underwent the same medical examinations and endoscopy. The average follow up time was 13.8 months in Gr.I and 14.7 months in Gr.II.
Results: The postoperative functional follow up showed that after LARS the lower esophagus sphincter (LES) pressure increased (Gr.I: 12.1 vs 17.8 Hgmm and Gr.II. 12.6 Hgmm vs 18.5 Hgmm, p < 0.05), and the DeMeester score decreased (Gr.I: 21.9 vs 7.7 and Gr.II: 27.9 vs 12.7, p < 0.05) in both groups. There were no significant differences between the DeMeester scores (21.9 versus 27.9, p = 0.546) and the LES pressures (17.8 Hgmm vs 18.5 Hgmm, p = 0.892) of the groups. It is highlighted that Visick scores also showed an improvement in both groups (Gr.I: 81% vs Gr.II: 73%, p = 0.319).
Conclusions: The short term follow up showed that in the non-responder GERD patients’ group the efficiency of the laparoscopic antireflux surgery is non-inferior compared to the responder group. To verify the surgical treatment advantages in patients after failed long-term medical treatment further follow up is necessary.
Upper GI—benign esophageal disorders
P222—Laparoscopic Heller Myotomy with dor fundoplication—upper gastrointestinal quality of life before and after the surgery
Anna Marija Lescinska, I Ivanovs
Riga East University Hospital, Surgery, Latvia
Aims: The aim of the study to access the short-term efficacy and quality of life (QoL) of patients with achalasia after laparoscopic Heller myotomy and Dor fundoplication.
Methods: Prospective case controlled study was done in Riga East University Hospital (Latvia). Fourteen achalasia patients underwent laparoscopic Heller myotomy and Dor fundoplication from July 2016 to June 2020. The data on clinical evaluation and QoL before therapy and after the operation was collected and analyzed. Eckard clinical scoring system and Gastrointestinal Quality of Life Index scores were used.
Results: All the fourteen patients underwent laparoscopic Heller myotomy and posterior fundoplication successfully. By comparing the data of the preoperative and postoperative period after Heller myotomy, we found that the mean Eckardt score decreased from 2,125 to 0,285 (p < 0,05) and postoperative QOL scores were higher than those of preoperative. There were no complications. Not only items assessing gastrointestinal symptoms but also the domains of physical, social, and emotional function significantly improved. The most marked improvements were achieved in patients with the lowest preoperative scores.
Conclusions: Laparoscopic Heller myotomy with Dor fundoplication is safe and effective method for treating achalasia in the short-term, it can relieve clinic symptoms as well as improve patients’ QOL. Laparoscopic Heller myotomy with partial posterior fundoplication is technically feasible and effectively prevents reflux symptoms. Quality of life assessed with generic and disease-specific validated instruments significantly improved after laparoscopic Heller myotomy combined with Dor fundoplication.
Upper GI—benign esophageal disorders
P223—Surgical option for Boerhaave syndrome (clinical observation)
Vladislav Bombizo, P.N. Buldakov, A.A. Averkina, D.N. Ustinov, E.A. Tseimakh
Regional Clinical Hospital of Emergency Medical Care, Department of Healthcare of the Russian Federation, Russia
Introduction: Spontaneous ruptures of the esophagus account for 2–3% of all observations of damage to the esophagus. According to most authors, surgical intervention is the main method of treating spontaneous rupture of the esophagus. Postoperative mortality in this case is 25–85%, which is due to the development of serious purulent complications.
Research objective: Determine the possibility of using thoracoscopic access in case of rupture of the esophagus.
Materials and methods: A 45-year-old patient was admitted to the clinic 30 min after the onset of the disease with complaints of intense pain behind the breastbone and in the epigastric region, nausea, vomiting of food eaten, weakness. The disease began after a heavy meal. On admission, the body temperature is 38.2 °C, the blood pressure is 90/60 mm Hg, the pulse is 114 per minute, and the respiratory rate is 26 per minute. On the X-ray of the chest organs on the left, total darkening of the left pulmonary field with a shift of the mediastinal organs to the right was determined. Computed tomograms of the chest organs showed pneumomediastinum, hydropneumothorax on the left, hydrothorax on the right. During ultrasound examination, free fluid of a heterogeneous structure was located in the pleural cavities. Drainage of the left and right pleural cavity was performed. Removed 400 ml of turbid serous exudate with food debris and air on the left and 300 ml of turbid serous exudate on the right. According to emergency indications under endotracheal anesthesia with one-pulmonary intubation, videothoracoscopy was performed on the left. From the pleural cavity removed 500 ml of turbid effusion with food debris. The mediastinal pleura was dissected, a linear longitudinal defect 3 cm long on the left wall of the epiphrenal segment of the esophagus was revealed. To improve the visualization of the defect, the method of transillumination was used during intraoperative esophagoscopy. The esophageal defect is sutured with a double-row continuous suture using a synthetic absorbable material. The intrathoracic stage of the operation was completed by draining the posterior lower mediastinum with two silicone tubes and draining the pleural cavity. Then video-assisted jejunostomy was performed. On the 12th day after surgery, computed tomography revealed edema and infiltration of the lower mediastinal tissue more on the right, signs of fluid formation with the presence of gas paraesophageally on the right and bilateral pleurisy. Transabdominal access and mediastinotomy were performed, purulent contents were obtained from the posterior mediastinum on the right. The operation was completed by draining the posterior lower mediastinum with silicone tubes. Within 16 days—flow-aspiration dialysis of the mediastinal tissue. On the 28th day, contrasting of the esophagus was performed, there were no contrast streaks outside the esophagus. Natural nutrition was resumed, the jejunostomy tube was removed. On the 30th day, the drains from the mediastinum were removed. On the 35th day, the patient was discharged under the supervision of a surgeon at the place of residence. The patient was examined 6 months later and one year after discharge. She does not note dysphagia, she gained 7 kg in body weight. During esophagoscopy, the esophageal mucosa is smooth, the patency is satisfactory. Computed tomography of the chest organs showed postoperative adhesive changes in the pleural cavities.
Results: This clinical observation indicates the possibility of a multistage approach to the treatment of patients with Boerhaave's syndrome. The choice of videothoracoscopy as an access to the esophagus is justified by the convenience of eliminating the defect with drainage of the tissue of the mediastinum and pleural cavity under visual control, as well as by low injury.
Conclusions: Thus, in the surgery of esophageal injuries in some patients, a staged approach can be used, which implies the priority elimination of life-threatening manifestations of the disease using minimally invasive surgical techniques. Subsequently, with the stabilization of the state, additional correction of the complications arising is performed.

Upper GI—benign esophageal disorders
P224—Efficiency of combination of endoscopic and endovascular treatment of patients with esophageal variceal bleeding
National Pirogov Memorial Medical University, Vinnytsya, Department of Endoscopic and Cardiovascular Surgery, Ukraine
Aim: The aim of the study was to evaluate of the efficiency of combination of endoscopic and endovascular treatment of patients with esophageal varices bleeding.
Methods: The study included 258 patients with esophageal varices bleeding. Total number of men – 147 (56.98%), women – 111 (43.02%). The average age of patients was 57,4 ± 4,1 years. The source of bleeding was identified during endoscopy. All patients received drug therapy – non-selective beta-blockers, hemostatic, antisecretory, infusion, symptomatic. Patients of group 1 (n = 195) received just drug therapy. Patients of group 2 (n = 63) received minimally invasive endoscopic surgical interventions such as endoscopic band ligation of bleeding esophageal varices. Subsequently, to reduce portal hypertension and on purpose to prevent new varices emergence the splenic artery embolization was performed.
Results: The average age of patients in group 1 was 57.0 ± 4.3 years. Using just drug therapy we have stopped bleeding in 152 (77.95%) cases. In all cases at the end of treatment we received improvement of clinical and laboratory indices. 43 patients (22.05%) were died. Duration of treatment was 10.2 ± 2.1 days.
The average age of patients in group 2 was 57.8 ± 5.7 years. Performing of endoscopic band ligation and splenic artery embolization we have stopped bleeding in 55 (87.30%) cases. In all cases at the end of treatment we received improvement of clinical and laboratory indices. 8 patients (12.70%) were died. Duration of treatment was 6.8 ± 2.7 days.
Conclusion: Under the condition of esophageal varices bleeding treatment by performing the combination of endoscopic and endovascular treatment in comparison with only drug therapy we can see the improvement of patient’s condition, decreasing of mortality and duration of treatment.
Upper GI—benign esophageal disorders
P225—Surgical indication decided by simple reflux test and results of laparoscopic Nissen fundoplication for Gerd patients
Tatsushi Suwa, A. Obana, K. Iwasaki, N. Koide, S. Usui, K. Kitamura, T. Matumura, M. Nakayama, K. Karikomi, M. Koyama, Y. Sato, R. Yoshida, H. Suzuki, S. Masamura, H. Nomori
Kashiwa Kousei General Hospital, Surgery, Japan
Introduction: The indication of laparoscopic anti-reflux surgery for GERD patients is difficult to be judged fairly. We have established simple “Reflux Test “ as the tool to decide surgical indication for GERD patients.
Surgical indication: Reflux Test.
At the standing position a patient swallows 300 ml barium solution. After total solution goes into stomach, a patient lies down at the flat position. Then a patient changes the position to left lateral decubitus position, flat position, right lateral decubitus position and flat position again every 10 s in the order. During this procedure, gastro-esophageal reflux was evaluated and assigned to severe, moderate and slight category. If the reflux was observed slightly up to cervical esophagus, the case was assigned to moderate category. The anti-reflux surgery was considered in the moderate and severe categories.
Results: We have performed laparoscopic Nissen procedure in 117 cases. Median follow-up period of this study was 75 months (0–132 months). In 15 cases (11.4%) PPI was restarted before 6 months after the anti-reflux surgery. In 29 cases (24.8%) PPI was restarted after the anti-reflux surgery during the whole follow-up period of this study. The results of the study have shown that the reflux esophagitis was improved obviously after the anti-reflux surgery even in the PPI restarted group which was analyzed by our endoscopic esophagitis grading score (p < 0.001).
Conclusion: The anti-reflux surgery is most effective for the patients suffering from obvious gastro-esophageal reflux. The results of the laparoscopic Nissen fundoplication were good and satisfied by the patients mostly.
Upper GI—benign esophageal disorders
P226—Our stylized procedure with right side approach in laparoscopic nissen fundoplication for gerd patients
Tatsushi Suwa, A. Obana, K. Iwasaki, N. Koide, S. Usui, K. Kitamura, T. Matumura, M. Nakayama, K. Karikomi, M. Koyama, Y .Sato, R. Yoshida, H. Suzuki, S. Masamura, H. Nomori
Kashiwa Kousei General Hospital, Surgery, Japan
Introduction: Laparoscopic techniques in anti-reflux surgery for GERD patients are still considered complicated. We have established our simple anti-reflux surgery procedure with right side approach contributing to less bleeding and less operative time.
Suregical Surgical procedure: Setting.
Our 5-trocar setting with patients in the reverse Trendelenburg's position is as follows: 12 mm trocar just below the navel (A), 5 mm trocar at the upper right abdomen for pulling up the liver, 5 mm trocar at upper right, 12 mm trocar at upper left (B), 5 mm trocar at middle left (C).
Step 1Right Side Approach.
Left part of the lesser omentum was cut with preserving the hepatic branch of vagus nerve. The right crus of the diaphragma has been dissected free from the soft tissue around the stomach and abdominal esophagus. In this step the fascia of the right crus should be preserved and the soft tissue should not been damaged to avoid unnecessary bleeding. After cutting the peritoneum just inside the right crus, the soft tissue was dissected bluntly to left side. Then the inside and outside margins of the left crus of the diaphragma were recognized from the right side. The laparoscope uses trocar (A), the assistant uses trocar (B) to pull the stomach and the operator’s right hand uses trocar (C).
Step 2Flap Preparation.
The branches of left gastroepiploic vessels and the short gastric vessels were divided. The left crus of the diaphragma was exposed and the window at the posterior side of the abdominal esophagus was shown and widely opened. The laparoscope uses trocar (A) at the beginning of dividing left gastroepiploic vessels, trocar (B) when dividing short gastric vessels.
Step 3Suturing.
The right and left crus are sutured with interrupted stitches to reduce the hiatus. From the right side, the fundus of the stomach is grasped through the window behind the abdominal esophagus. Then the fundus of the stomach is pulled to obtain a 360 degree "stomach-wrap" around the abdominal esophagus. Stitches are placed between both gastric flaps.
Results: We have performed this procedure in 116 cases. The mean operation time in recent 20 cases is 90 min. The patients are mostly satisfied with the postoperative results because of stable food passage food and no reflux.
Upper GI—benign esophageal disorders
P227—Are biopsies taken during OGDs for oesophageal dysphagia from an Irish Institute Optimal?
Mohamed Salama1, Mahmoud Salama2, H. Babur4, A. Salama3, B. Sami1
1Our Lady of Lourdes Hospital, General Surgery, Drogheda, 2Trinity College Dublin, 3NUI Galway, Ireland. 4Plovdiv Medical University, Bulgaria
Introduction: NICE and BSG guidelines recommend dysphagia be investigated with OGD. In patients with unknown cause, biopsies should be taken from two oesophageal sites to out-rule eosinophilic oesophagitis.
Aims: To investigate proportion of dysphagic patients who underwent biopsy during OGD · To determine prevalence of each finding in patients with dysphagia
Methods: All OGDs performed for dysphagia between January 2017 and December 2018 in OLOLH, were included. Any OGD performed in theatre or with contraindications for biopsy were excluded. A systematic review was done via pubmed, SCOPUS, Cochrane database and Medline.
Results: The total number of patients was 249 (Female 146: Male 103) with age range between 16–96 years and mean age of 63 years. OGD findings: 61 Hiatus hernias, 50 Normal, 2 food boluses, 47 Gastritis, 25 Oesophagitis, 17 oesophageal strictures, 11 Schatzki ring, 9 Duodenitis, 7 oesophageal candidas, 7 oesophageal diverticulae, 4 Gastric ulcers, 3 gastric cancers, 3 oesophageal ulcers, 2 achalasia, 2 Varices, 1 Oesophageal cancer, 1 Oropharyngeal cancer, 1 oesophageal polyp, 1 Duodenal ulcer. 82 patients had oesophageal biopsies (Female 40; Male 42). Histology results: 43 Normal, 15 Inflammation, 2 Metaplasia, 6 Reflux, 4 Benign ulcer, 3 Adenocarcinoma, 3 SCC, 2 Eosinophilic, 2 Candida, 1 Benign leiomyoma, 1 HSV Of 50 normal OGDs, 14 had biopsies: 1 eosinophilic oesophagitis, 1 mild oesophagitis, 1 chronic esophagitis, 11 normal.
Conclusions: · Compliance with guidelines is suboptimal. · One third of OGDs for dysphagic patients had biopsies. · Over half of the biopsies were normal. · 2.4% of total or 7% of otherwise normal OGDS had eosinophilic oesophagitis. · Selective biopsies may be more appropriate.
Upper GI—benign esophageal disorders
P228—Management of recurrent hiatal hernia
Islam Omar
Sunderland Royal Hospital, South Tyneside and Sunderland NHS Trust, Bariatric Unit, Department of General Surgery, United Kingdom
Background: Recurrent hiatal hernia is defined as the presence of the stomach > 2 cm above the hiatus. The reported recurrence rate following hiatal hernia repair is variable and time dependent, ranging from 1.2% up to 66%. Most recurrences are small, of the sliding type, asymptomatic and are picked up via endoscopy or imaging.
Case presentation: A 40-year-old female patient presented with a 2-day history of chest pain, nausea and vomiting. She had regular bowel movements and no urinary symptoms. She had a surgical history of laparoscopic repair of a small hiatal hernia (Fig. 1) and a Nissen fundoplication 3 years earlier.
She was clinically stable on examination and her abdomen was soft and lax with tenderness on deep palpation over the epigastrium. There was a negative Murphy’s sign and there was no guarding. Her chest was clear with normal heart sounds, Bloods were normal (HGB 136, WBC 11.1 and CRP 7.7) and her ABG showed a normal PH and lactate. The patient was admitted and an emergency ultrasound scan was carried out which was negative. The following CT scan however showed suspected recurrent hiatal hernia with a small amount of pericardial effusion (Fig. 2). Cardiac assessments including an ECG, echocardiography and cardiac enzymes ruled out any cardiac abnormality. A gastroscopy was performed (Fig. 3) which confirmed the presence of a widened hiatal ring, a paraoesophageal hernia and wrap migration of 2 cm length.
Although the patient remained vitally stable with normal inflammatory markers and lactate levels, the patient’s pain did not settle down with analgesic. Consequently, the decision was taken to proceed with the surgical option. A laparoscopic exploration confirmed the presence of a paraoesophageal hiatal hernia < 5 cm.
Differential diagnosis: A swiftly arranged CT scan and gastroscopy helped to make an early diagnosis and exclude any cardiac cause such as pericarditis.
Treatment: Surgical technique:
A pneumoperitoneum was created using a Veress needle and 5 standard ports were introduced (2 ports 11 mm and 3 ports 5 mm). Infra-oesophageal adhesiolysis was carried out to display the hiatus, oesophagus and the stomach. The stomach was reduced into the abdominal cavity and the fundus was mobilised. Sharp and blunt dissection was done to separate the liver from the stomach. The paraoesophageal hernia was reduced and a pad of fat at the angle of His was excised. The hernia sac was identified and excised. The lower oesophagus and the crura were mobilised with the identification and preservation of both Vagi.
A 5-mm defect in the left pleura was identified and closed. A posterior crural repair has been done with 2 close interrupted 0/0 Ethibond sutures. A gastropexy was done using 0/0 Ethibond at the 4 and 2 o’clock positions. Intraoperative OGD was performed which showed the hiatal repair was not tight. Finally, a 15 Robinson’s drain was inserted in the hiatus and haemostasis was achieved.
The patient was moved to the intensive care unit for one day before being transferred to the general ward. The drain was removed 48 h after surgery and the patient was discharged. Two days later, the patient was reviewed in acute surgical unit on a planned basis where she had made a full recovery.
Learning points/take home messages:
High index of suspicion is necessary to detect a wrap migration or recurrent incarcerated hernia.
CT cannot differentiate recurrent paraoesophageal from sliding hiatal hernia. Gastroscopy and /or barium swallow are helpful in diagnosis.
A multidisciplinary approach throughout the management process is essential to reach a correct diagnosis and to manage possible complications.
Once diagnosis has been established urgent surgical intervention is advised.
Upper GI—esophageal cancer
P229—Re-thoracoscopy in the prone position as a therapeutic complement in the treatment of leakage following Ivor Lewis esophagectomy
Raquel Escalera Pérez1, Seamus Mac Mathuna1, C. Medina Achirica2, S. Mac Mathuna1, M. Diaz Oteros2, F. Mateo Vallejo2, F. García Molina1
Hospital Universitario de Jerez, 1General Surgery, 2Esophagogastric, Spain
Aims: Esophagogastric anastomotic leakage is a frequent and difficult to treat complication of esophagectomy, presenting elevated morbimortality. Most fistulas, especially type III in the Larburu et al. classification require a drainage of the thoracic cavity and the placement of a prosthesis. For this, we propose a minimally invasive approach such as re-thoracoscopy as a reproducible alternative after having endoscopically confirmed the viability of the plasty and collocated the prothesis.
Methods: We present the case of a 57-year-old male patient who underwent a minimally invasive Ivor Lewis type esophagectomy with a thoracoscopic approach in the prone position for well differentiated stage IIA (T2N1M0) adenocarcinoma of the EGJ/cardia. The patient’s personal history featured: smoker, pseudotumor cerebri with intracranial HT and lumboperitoneal shunt.
Results: The immediate postoperative period was favorable, beginning early oral tolerance with no evidence of leakage. On the 5th postoperative day, he presented an abrupt clinical deterioration with acute dyspnea. An urgent CT scan was performed, in which a fistula was observed. A metal stent was placed by urgent oral endoscopy, during which a dehiscence of 1/3 of the lumen was visualized, with no evidence of ischemia of the plasty. Following a torpid clinical evolution a new chest CT scan was performed, revealing an important right hydropneumothorax, with dimensions of more than 10 cm. in anteroposterior, craniocaudal and transverse diameters, multiloculated and producing compressive atelectasis. Contrast extravasation through a leakage into the right pleural space was observed. Given these findings, a new surgical intervention involving a re-thoracoscopy was performed to drain and debride all debris from the pleural cavity. An extensive lavage of the cavity was performed and an axion-type drain was left in the lung apex. The patient subsequently presented a favorable clinical evolution, a barium swallow test showed no evidence of leakage, with discharge 35 days after admission.
Conclusion: Esophageal fistulas and necrosis of the plasty are the most feared complications of esophagectomy, not forgetting mediastinitis, empyema and retropharyngeal abscess.
There are no widely accepted classifications for leakages, which makes their management difficult.
In our experience, early detection and aggressive management with drainage, mediastinal lavage, and the use of endoprostheses seem central to successful rescue.
In centers with experience in thoracoscopy for the esophageal approach, we consider it necessary to consider re-thoracoscopy as an effective and minimally invasive alternative in patients with hemodynamic stability as a complement to the placement of endoprostheses for empyema lavage.

Upper GI—esophageal cancer
P231—Management of intraoperative accidents in minimally invasive esophagectomy for thoracic esophageal cancer
Silviu Constantinoiu, F. Achim, A. Constantin, R. Birlă, M. Gheorghe, P. Hoara, R. Tomsa, D. Predescu
Sf Maria Clinical Hospital, Carol Davila University of Medicine and Pharmacy, Bucharest, General and Esophageal Surgery Clinic, Center of Excellence in Esophageal Surgery, Romania
Introduction: Intraoperative management of patients undergoing esophageal surgery can be difficult due to a variety of surgical and anesthetic problems. Thoracoscopic mediastinal dissection can be technically difficult due to anatomical, clinicopathological factors (tumor stage) or post-chemoradiotherapy adhesions.
Material and Method: We present the experience of the Center of Excellence in Esophageal Surgery at Sf. Maria Clinical Hospital Bucharest regarding management of intraoperative accidents in minimally invasive esophagectomy for thoracic esophageal cancer.
Results: During the learning curve we encountered multiple intraoperative incidents (damage of the diaphragm muscle, thoracic duct, right upper pulmonary lobe, left pleura). Hemorrhagic incidents were resolved by minimally invasive approach seconds before decision for conversion to open surgery. Laparoscopic mobilization of the stomach was associated with a risk of bleeding or injury to the left gastro-epiploic pedicle, spleen and transverse colon. Evaluation of venous drainage, optimal sizing of the hiatus, avoidance of tension in the graft by proper mobilization including duodeno-pancreatic dissection laparoscopically were significant factors in preventing ischemia of gastric conduit.
Conclusions: The consequences of intraoperative unrecognized intraoperative accidents become evident in the postoperative period (chylothorax after the thoracic canal section, paralysis of the left recurrent nerve, air fistula). Communication between the surgical and anesthetic team is essential to prevent any incidents and decisive for management of the injuries without conversion to open surgery.
Keywords: intraoperative accidents, minimally invasive esophagectomy, thoracic esophageal cancer, thoraco-laparoscopic approach.
Upper GI—esophageal cancer
P232—Artificial Intelligence in Upper Gastrointestinal Endoscopy, A Scoping review
Eoghan Burke
St Lukes Kilkenny, Surgery, Ireland
Introduction: The use of Artificial Intelligence (AI) in medicine is accelerating. Recently there have been significant advancements made in its role in upper GI endoscopy.
Aim:To assess current research questions exploring the use of AI in diagnosing upper GI pathology at endoscopy.
Methods: A scoping review of studies published on PubMed over the last 5 years using the search string: (((artificial intelligence) OR AI)) AND (Gastroscopy OR OGD OR EGD OR oesophagus OR esophagus OR stomach OR Gastric) was conducted.
Inclusion criteria: retrospective and prospective studies, published in the English language. Data extracted: country of origin for the research, clinical question, demographics, form of AI and study design.
Results: Search run on 5thof February 2020 yielded 2542 results. Articles meeting inclusion criteria numbered 25. Research originated in: Japan (32%), Europe (24%), China (20%), South Korea (8%), other (16%). Clinical questions being explored included: use of AI for detecting gastric cancer, assessing depth of gastric cancer invasion, detecting early neoplasia in Barrett’s Oesophagus, real time gastric polyp detection and H.Pylori infection status.
Conclusion: AI use in upper GI endoscopy is being evaluated at an increasing rate. Surgeons must be ready to gain a working knowledge of this technology to safely interpret its results.
Upper GI—esophageal cancer
P233—Hand-sewn robot-assisted anastomosis during Ivor-Lewis oesophagectomy
Ismael Diez del Val, C. Loureiro Gonzalez, S. Leturio Fernandez, J. Castro Vazquez, A. Moro Delgado, M.M. Garcia Fernandez, J. Barrenetxea Asua, J. Ortiz Lacorzana
Basurto University Hospital, Oesophagogastric & Bariatric Surgery, Bilbao, Spain
Introduction: Oesophagectomy is a complex procedure for complex patients frequently submitted to neoadjuvant therapy. The Ivor-Lewis technique is the treatment of choice for neoplasms of the lower third and EGJ. Controversy exists related to the best method to perform the anastomosis. Robotic assistance could mean a significant step towards excellence.
Patients and Methods: From 2008 to 2020, 160 oesophagectomies have been performed in our Unit. For tumors located in the lower third of the oesophagus and EGJ, we usually approach the abdomen by conventional laparoscopy, verifying resectability and proceeding to gastric tubulization, lymphadenectomy around the lesser curvature and celiac trunk and piloroplasty. The specimen and the plasty are introduced into the right pleura before placing the patient in the prone position.
During thoracoscopy, a careful dissection of the oesophagus with ligation of the thoracic duct and extended lymphadenectomy is carried out, and the Da Vinci system docked to permit a comfortable barbed running suture wrapped with an omental patch.
Results: From May 2011 on, 68 patients (58 men and 10 women) have been submitted to an Ivor-Lewis oesophagectomy with a hand-sewn suture in the prone position. Mean age was 60.04 years. There were 51 adenocarcinomas, 14 squamous cell cancers and 3 benign conditions. Four tumours were in the middle third, 41 in the distal oesophagus, 14 Siewert I and 6 Siewert II. Forty-eight patients were treated preoperatively, 43 with RCT and 5 with chemotherapy alone. The 20 other patients were as follows: 3 benign, 14 T1-2N0, 2 were older than 75 and in 1 patient neoadjuvant therapy was contraindicated due to comorbidity.
There were 8 conversions to an open thoracotomy. Complications were distributed following Clavien-Dindo: 35 patients had no complications (51.5%), 5 grade I, 8 grade II, 11 grade IIIa, 4 IIIb, 1 IVb and 4 patients died in-hospital (Mortality rate of 5.9%).
Twelve patients (17.6%) had a leak, one of them requiring resection of the gastric plasty for ischemia, with oesophagostomy and jejunostomy. Six cases (8.8%) needed a reoperation.
The quality of the resection was high, with a median of 29 lymph nodes harvested (IQ range: 22–38), more than 15 nodes in 92.3% (60/65) and an R0 of 98.5% (64/65).
The median length of stay was 11 days (IQ range: 10–17).
Discussion: Robot-assisted with a hand-sewn suture in the prone position seems to be an interesting option for anastomosis in the Ivor-Lewis procedure. The versatility of the robotic instruments permits to perform a comfortable and safe suture, with a complication rate similar to the stapled alternatives. Once the learning curve has been overcome, if a minimum hospital volume can be guaranteed, it could be the technique providing the best results in the future. Of course, larger series are needed.
Upper GI—esophageal cancer
P234—The learning curve associated with new mini-invasive techniques of hybrid (laparoscopic) Ivor Lewis esophagectomies
Yevhenii Shudrak, Y. Kondratskii, N. Koval, A. Kolesnyk, A. Minich, O. Dobrzhanskyi, A. Shudrak, R. Fridel, Y. Nazarov, N. Shudrak1
National Cancer Institute, Upper GI tumors, 1Oncology, Ukraine
Aims: Our aim was to analyze results, structure and complications of hybrid (laparoscopic) Ivor Lewis esophagectomies (HILE) in terms from 2017 to 2019 due to analyze influence of the learning curve on overall morbidity and mortality.
Methods: All HILE were divided in two groups, I group – operations from 2017 to 2018 and II – HILE in 2019.
Results: In the NCI 45 HILE were performed from 2017 to 2019 – for esophageal junction cancer (26) and for esophageal cancer (19).
In total in group I 25 HILE were performed. The overall morbidity was 44% (11 people). The overall mortality rate during this period was 16% (4 people).
In total in group II 20 HILE were performed. The overall morbidity was 35% (7 people). The overall mortality rate was 5% (1 person).
Conclusions: Due to recent surgical innovations, which are complex, the significance of learning curves is increasing. Surgical learning curves of HILE is associated with increased morbidity and mortality. A decrease in mortality and morbidity can be seen while comparing results of group I and group II, which can be related to the learning curve associated with any new especially minimally invasive techniques.
Upper GI—esophageal cancer
P236—The experience of using Minimally-invasive I. Lewis esophagectomy
Andrii Klimas, O. Usenko, A. Sidyuk, O. Sidyuk, G. Savenko, O. Teslia, K. Nadein
“Shalimov`s National Institute of Surgery and Transplantology NAMS of Ukraine”, Thoraco-abdominal surgery, Ukraine
Aim: Esophagectomy is a complex operation,caused by pathology, complexity of anatomical and topographic location of the esophagus, and high trauma and duration of intervention, and is associated with a significant frequency of postoperative complications and mortality. According to current trends in the world, MIE has become widespread as an alternative to open access.
Materials and methods: Shalimov`s NIST was performed 46 esophagectomies according to I.Lewis were performed on patients with adenocarcinoma of the middle and lower third of the esophagus. The study group included 21 IECs according to I. Lewis with laparoscopic stage and video-assisted thoracoscopic stage, the comparison group included 25 patients with open esophagectomy according to I. Lewis. The average age of patients was 53 years (47–64). All patients developed an intrapleural esophageal-gastric anastomosis.
Results and discussion: The average MIE time for I. Lewis was 403 min. (370–480 min), the average volume of blood loss was 101 ml (50–200 ml), the average time of stay in the intensive care unit was 1 day and inpatient postoperative treatment was 10 days (8–16). Complications: 1 patient (4.7%) had acute strangulation small intestinal obstruction, due to which the patient underwent laparoscopic removal of intestinal obstruction. There were no postoperative cardiorespiratory complications or fatalities. In the comparison group: the average operation time was 282 min (235–380 min.), the average volume of blood loss is 350 ml (100–600 ml), the average time of stay in the intensive care unit was 3 days and inpatient postoperative treatment—15 days (9–29). One patient in the p/o period developed adhesive small bowel obstruction (relaparotomy and separation of adhesions were performed), and 12 patients were diagnosed with postoperative pneumonia.
Conclusions: Minimally invasive esophagoectomy is an adequate surgical procedure for the treatment of malignant and benign diseases of the esophagus, which reduces postoperative trauma, hospital stay and reduce blood loss.
Upper GI—esophageal cancer
P326—Use of Indocyanine Green Fluorescence (ICG) for reconstruction with ROUX-EN-Y after minimally invasive Ivor-Lewis esophagectomy in a patient with a previous open total
Andres Navarrete
Clínica Alemana/Hospital Militar, Surgery, Chile
Esophagectomy is a procedure with considerable morbidity and mortality despite all the perioperative advances. Reconstruction is a cornerstone in this patients and may determine there postoperative course and future quality of life. Most of the times gastric conduit is the choice for recosntruction, the problem is when the stomach is not available and we need to decide the best alternative.
Methods: Case Report of minimally invasive Ivor Lewis with the use of ICG for reconstruction with a Roux-en-Y.
Results: We present a case of a 57 years old male with a previous open total gastrectomy due to a upper third gastric cancer performed in 2017. The pathology confirmed an adenocarcinoma with moderate differentiation and compromise up to the muscularis propia. Negative proximal and distal margin where achieved and 0 of 32 lymph nodes were collected. During the follow-up, at the 2 year, a 2 cm lession was found in the esophagic mucosa inmediately above de esophajejunal anatomosis. The pathology confirmed an adenocarcinoma. The endoscopic ultrasound demonstrated compromised of the muscularis propia of the esophagus and computed tomography showed not other pathological findings. Surgical resection was decided and a minimally invasive Ivor-Lewis with an Roux-en-Y was planned. We decided that to use of indocyanine green for preparation and evaluation of the jejunum tube. The surgery was performed completely with minimally invasive access. During the postoperative course the patient was refeed at day 3 and discharge at day 7 without any postoperative complicaction. CT scan an endoscopy was done at 12 month of follow-up and no pathologic findings were found.
Conclusion: Roux-en-Y is an alternative in the reconstruction after esophagectomy if stomach is not available. The use of ICG is a valuable tool in the construction of the jejunum limb optimazing the visualization of the jejunal vascular arcade and also in evaluating the jejunun perfusion before performing the anastomosis.
Upper GI—gastric cancer
P237—"Many Ways to Skin Gastric Cancer"—Robotic versus Laparoscopic versus Open Gastrectomy
Eli Kakiashvili
Galilee medical center, general surgery, Israel
Aim: robotic techniques relevance in gastric cancer surgery is being examined.
The study presents comparison of perioperative outcome between different surgical approaches for gastric adenocarcinoma (AC).
Methods: retrospective cohort of 85 patients that underwent gastrectomy for (AC) at Rambam Hospital during 2012–2016. Patients data was collected based on demographic characteristics, BMI, operating room time (ORT), number of lymph nodes (LN), length of hospitalization (LOH), and perioperative complications.
Results: study population included 55 patients after total gastrectomies, 10 of them robotic and 30 partial gastrectomies, 12 of them robotic. Age, gender and BMI were similar between patients who underwent any type of procedures.
Median length of hospitalization (LOH) for robotic total gastrectomy was 4.5 days and it was significantly shorter than both laparoscopic total gastrectomy (LTG) 7.0 days (p = 0.003) and open total gastrectomy (OTG) 9.0 days (p < 0.001). Similar significant differences in (LOH) between the groups were observed among patients who underwent partial gastrectomy, but the comparison between robotic and laparoscopic procedures was limited due to small numbers of (LPG).
Median(ORT) was significantly longer among robotic gastrectomies compared to open, the difference was 64 min in total gastrectomy group and 145 min in partial gastrectomy group (p < 0.001 for both differences), but the difference in(ORT) between laparoscopic and robotic procedures were smaller and non-significant.
The number of dissected (LN) was similar between the 3 procedures in total gasrectomies. In partial gastrectomies, the number of dissected (LN) was even higher among both laparoscopic and robotic gastrectomies compared to open (p < 0.001).)
Conclusions: robotic total and partial gastrectomies for gastric (AC) are associated with oncologically adequate lymphadenectomy and faster patient recovery, but longer ORT.
Upper GI—gastric cancer
P238—Non-surgical treatment of esophago-jejunal anastomotic leakage
Oleksii Dobrzhanskyi, Y. Kondratskyi, R. Fridel, A. Minich, A. Kolesnyk, Y. Shudrak, N. Koval
National Cancer Institute, Upper gastrointestinal tumors department, Ukraine
Aim: Esophagojejunal anastomotic leakage (EJAL) is a life-threatening complication after total gastrectomy (TG) leading to high morbidity and mortality rates and it traditionally requires surgical treatment. The alternative to surgery is stent placement into the area of partial anastomotic defect with local drainage control or using endo-VAC system. The aim of the investigation was to assess length of hospital stay and mortality rate.
Methods: From November 2017 to November 2020 315 TG were performed in our department. Rate of EJAL was 6,3% (20 patients). We retrospectively randomized patients into two groups: those who underwent surgical treatment and those who underwent stent placement. We did not use endo-VAC system within that period. We assessed EJAL using computed tomography and endoscopy and then we followed particular treatment pathway. 11 (55%) patients underwent endoscopic stent placement in the area of defect in anastomosis augmented by local drainage and placement of naso-intestinal tube. Another 9 (45%) patients underwent surgical exploration with further external esophagostomy or esophageal stump formation and nutritional jejunostomy.
Results: 3 (33,3%) patents died in group of surgical treatment and 2 (18,2%) patient died after stent placement due to unable of getting control of loco-regional para-anastomotic infectious process. Median hospital stay after treatment of leakage among patients with stent comprised 16,7 days (9 – 24 days) and 34,8 days (19 – 44 days) in the group of patients who underwent surgical exploration. Mortality rate comprised 18.2% and 33.3%, respectively.
Conclusion: Treatment of EJAL using stents, naso-intestinal tubes and local drainage control appears to have benefit in patients who developed EJAL. Further studies are needed to develop patient stratification models for stent placement and surgical exploration.
Upper GI—gastric cancer
P239—Preservation of both replaced common hepatic and gastroduodenal arteries during laparoscopic D2 lymphadenectomy for gastric cancer: a case report
Lara Blanco Terés1, M .Bruna Esteban2, F.J. Vaqué Urbaneja2, F. Mingol Navarro2, L. Avelino González2, A. Batista Doménech3
1Hospital Universitario La Princesa, General Surgery, Hospital Universitario La Fe, 2General Surgery, 3Radiodiagnostic Service, Spain
Introduction: Anatomical variations of the celiac trunk (CT) branches are commonly described, which is important to know for successful and safe upper gastrointestinal tract surgery. Usually a variation occurs in either the right or left branches. However, in this reported case the variation occurs as a common replaced hepatic artery (rCHA) and a replaced gastroduodenal artery (rGDA) with an aberrant and separate origin during laparoscopic D2-lympahadenectomy for gastric cancer.
CASE REPORT: 75-year-old patient with a proximal local advanced gastric adenocarcinoma who had previously undergone neoadjuvant chemotherapy (FLOT-4 regimen), and was scheduled for a 3D minimally invasive total gastrectomy with D2 lymphadenectomy. Preoperative CT scan shows a variation of the CT branches anatomy, that will be identified during the dissection of the hepatoduodenal ligament (Fig. 1). A common hepatic artery originating from the superior mesenteric artery (SMA) was identified to the right of the portal vein. The entire arterial supply to the liver derived from this artery (rCHA). During the lymphadenectomy of the stations 7 and 9, a rGDA was identified from the CT, as well as the left gastric (LGA) and splenic artery (SA).
Right gastric artery (RGA) originating from the rCHA clearance was identified, skeletonized and divided. After careful dissection of the CT lymph nodes, LGA was ligated with hemolock clips preserving the rGDA (Fig. 2).
Total gastrectomy and Y-Roux esophagojejunostomy anastomosis was performed successfully. There was no need for conversion to an open procedure, and no postoperative complications or liver dysfunction was observed.
Several classifications for the hepatic arterial branching have been suggested. Our case is classified as a IX-type according to Michels’ classification system, which describes separate origins of common hepatic and gastroduodenal artery with a very low incidence (less than 1%).
CONCLUSION: This case emphasizes that preoperative imaging evaluation by computed tomography is obligated in upper gastrointestinal surgery in order to identify all arterial aberrancies like the rCHA. This vessel is highly exposed to injury risk during gastric cancer lymphadenectomy leading to intra-operative injury and post-operative bleeding or hepatic ischemia.

Upper GI—gastric cancer
P240—The computer will see you now
Assessing the quality and readability of information on gastric cancer on the Internet
Eoghan Burke
St Lukes Kilkenny, Surgery, Ireland
Background: Increasingly, patients are consulting the internet for medical information, where the quality and readability is highly variable. We must ensure patients are directed towards high quality websites. This is particularly true of Gastric Cancer (GC), a topic around which there is much uncertainty for patients and their families.
We aimed to assess the quality and readability of information on GC available for patients on the internet.
Methods and Materials: We searched the top 3 search engines for “Gastric Cancer”. We analysed the top 20 websites returned by Google and the top 10 websites returned by Yahoo and Bing. All free, English language websites which did not require a password were included. We excluded paid advertisement websites and websites for medical professionals. Duplicate websites were removed.
Each website was then evaluated using the JAMA benchmark criteria, DISCERN tool, presence or absence of the Health On The Internet (HON) seal and the Gastric Cancer Specific Content Score (GCSCS). Readability was assessed using both the Flesch Reading ease score (FRES) and the Flesch-Kincaid Grade level (FKGL).
Results: The average JAMA score was 1.55 with none of the twenty unique websites scoring the maximum of 4 points. The average DISCERN score was 54.8 ( 68.5%) with no website achieving the maximum of 80. The HON seal was present in only 6 websites (30%). The average GCSCS was 11 with only five websites achieving the maximum score of 13 (25%). The average FRES and FKGL were 52.7 and 9.7 respectively.
Conclusions: Whilst there are certainly websites providing high quality information for patients in relation to GC our study has identified obvious issues. We must ensure that only the highest quality information is available on the internet for patients and that the information is presented in a readable format.
Upper GI—gastric cancer
P241—Surgical approach of gastric plasmacytoma, an unusual type of cell plasmatic neoplasm
Tania Gómez Sanz, J.C. Trujillo Díaz, M. Ruiz Soriano, C. Jezieniecki Fernández, G. Cabezudo Molleda, H. Núñez Del Barrio, J. Herreros Rodrígez, B. De Andrés Asenjo, A. Vázquez Fernández, J. Beltrán de Heredia Rentería
University Clinic Hospital of Valladolid, General and Digestive Surgery, Spain
Introduction: Extramdeular plasmacytomas, characterized by monoclonal proliferation of plasma cells outside the bone marrow, are a rare presentation of monoclonal gammopathies (assuming < 5% of plasma cell neoplasms). They are usually located in the head or the neck, the stomach is in the second place. They generally appear in the fifth decade of life and they are more frequent in men. We present the case of a woman who debuted with severe anemia.
Case presentation A 43-year-old patient, with no relevant clinical history, was admitted to the Internal Medicine Service for the study and treatment of her anemia. The laboratory analyses of the admission showed: Hemoglobin 3.4 gr/dl and hematocrit 12.5%. A gastroscopy was performed and it showed a large ulcerated lesion in the greater curvature. The pathological report described an infiltration of the mucosa by mature and immature plasma cells with restriction of Kappa chains.In the thoraco-abdomino-pelvic CT (image 1), a large tumor, which captured contrast, was observed in a greater gastric curvature (65 × 50x90 mm) with intraluminal growth and lobulations in its lateral region.
We performed a laparoscopic approach,visualizing a gastric tumor dependent on a greater curvature, at the level of the mid-distal body, without revealing other space-occupying lesions. Atypical gastric resection was performed, opening the gastric cavity at the distal antro-body level, resecting the tumor on the anterior and posterior gastric side. She presented a satisfactory postoperative period, being discharged on the 6th day.
The pathological report described a a gastric tumour of lymphoid type which infiltrated the grastric wall throughout its thickness, it reached the surgical margin of resection. By immunohistochemistry, 10% Ki67, CD38 + and Kappa chain restriction are detected; all compatible with the diagnosis of gastric plasmacytoma.
The patient was referred to the Oncology Service, the oncologist decided to star treatment with radiotherapy.
Conclusion: The gastric plasmacytoma is an strange entity that is part of extramedullary plasmacytomas. The clinical manifestations are very non-specific. For its diagnosis, the presence of a tumour biopsy is necessary to demonstrate the presence of clonal plasma cells and they should not be presented in the bone marrow. The treatment of choice is the surgery; when we perform a complete resection, the role of radiotherapy or chemotherapy is unclear and does not improve relapse rates or disease-free survival; however, in the case of incomplete resection, the current recommendation is the administration of radiotherapy.
Upper GI—gastric cancer
P242—Simultaneous intraperitoneal cisplatin chemotherapy may be considered as a treatment for far advanced gastric cancer who undergone surgery
Eunju Lee, Kang, Lee, Won, Park, Ahn, Suh, Kim
Seoul National University Bundang Hospital, Department of general surgery, Korea
Introduction: Peritoneal seeding is the most common type of recurrence and cause of death for gastric cancer. Nevertheless, there is no established consensus for advanced gastric cancer with peritoneal seeding. This study aimed to analyze the effect of intraperitoneal (IP) cisplatin chemotherapy on the survival rate and oncological results of advanced gastric cancer patients who have undergone surgery.
Methods: Patients who underwent laparoscopic surgery including radical section, palliative surgery and intraperitoneal chemotherapy for primary gastric adenocarcinoma in our institution were retrospectively reviewed. In intraperitoneal chemotherapy group, 100 mg of cisplatin was administered intraperitoneally. The groups were propensity score matched in 1:1 ratio. Primary endpoint was survival rate and incidence of early postoperative complication.
Results: From January 2014 to December 2018, a total of 1373 patients underwent laparoscopic surgery, of which 50 were treated with intraperitoneal cisplatin chemotherapy. Because there were differences in the baseline characteristics between conventional group and the IP chemotherapy group, propensity score matching (PSM) was performed. After PSM, each group comprised of 32 patients. There was no significant difference in the early postoperative complications between the two groups (conventional group 12.3%, IP chemotherapy group 10%, p = 0.786). There was no statistical difference in overall survival between the conventional group and IP chemotherapy group (p = 0.75). In subgroup analysis, median survival was 15.7 ± 12.8 months in the conventional group and 18.6 ± 12.2 months in the IP chemotherapy group in stage IV gastric cancer.
Conclusion: This study showed that simultaneous IP cisplatin chemotherapy seemed to be considered treatment option for advanced gastric cancer.
Upper GI—gastric cancer
P243—Incidence of dumping syndrome after laparoscopic vagus nerve-preserving distal gastrectomy for early gastric cancer
So Kang, S.J. Lee, Y.S. Park, S.H. Ahn, Y.S. Suh, H.H. Kim
Seoul National University Bundang Hospital, Surgery, Korea
Objective: There is no consensus on what type of function-preserving gastrectomy can provide the best patient quality of life (QOL) for patients with gastric cancer. This study aims to evaluate the incidence of dumping syndrome after vagus nerve-preserving distal gastrectomy (VPNDG).
Methods: The study was designed as single-arm prospective observational phase II study with a follow-up period of 12 months. Patients diagnosed with early gastric cancer in the distal 2/3rd of the stomach were enrolled to undergo laparoscopic VPNDG with Roux-en Y gastrojejunostomy. Primary endpoint was incidence of dumping syndrome defined by Sigstad score 7 after 12-months. Other outcomes include operative data, complications, and patient QOL using the European Organization for Research and Treatment of Cancer C-30 and STO22 modules.
Results: One hundred patients underwent laparoscopic VPNDG from August 2017 to August 2019. Mean age was 60.1 ± 0.6 years with an average body mass index of 24.5 ± 3.1 kg/m2. Mean operation time was 167.0 ± 41.3 min, and blood loss was 26.8 ± 32.9 ml. After 12 months, 12 patients (12.0%) were classified as dumpers according to their Sigstad scores. Two patients had complication that needed invasive intervention. There was an increase in fatigue and diarrhea compared to preoperative QOL. Female gender was a significant risk factor for dumping syndrome in multivariate analysis (OR 4.37, 95% CI 1.31 – 17.27, p = 0.022).
Conclusion: About 12% of patients experienced dumping syndrome after laparoscopic VPNDG. Laparoscopic VPNDG can be performed safely with comparable outcomes on patient QOL after 1-year of follow-up.
Upper GI—gastric cancer
P244—Indocyanine green (ICG) fluorescence guided lymphadenectomy in laparoscopic radical gastrectomy for gastric cancer, a pilot study
Eugenio Licardie1, A. Senent-Boza2, L. García-Jimenez2, I. Alarcón-Del Agua2, M. Socas2, F. Francisco2, S. Morales-Conde2
1Quironsalud Sagrado Corazón, Department of General and Digestive Surgery, 2University Hospital Virgen del Rocio, Seville, Unit of innovation in Minimally Invasive Surgery And Unit of General and Digestive Surgery, Spain
Aims: Surgical treatment is the therapeutic basis for gastric cancer(GC). Performing a radical gastrectomy will involve a gastric resection with negative margins and an adequate lymphadenectomy that must guarantee not only oncological radicality but also adequate staging. However, there is still controversy about the number of lymph nodes(LN) required for optimal pathological staging and the type of lymphadenectomy depending on the histological nature of the tumour, its stage and its location.
The objective of the study is to assess the use of intraoperative ICG lymphogram for laparoscopic radical gastrectomy, in order to evaluate the existence of changes in the surgical attitude regarding the performance of lymphadenectomy.
Methods: Case series of 14 patients operated on for GC, who have been injected endoscopically in 4 quadrants around the tumour 12–24 h before surgery to perform ICG-guided lymphatic mapping(LM) intraoperatively. The patients have been operated by laparoscopy performing D2 lymphadenectomy. Anatomopathological data and short-term morbidity and mortality have been analyzed.
Results: 14 patients have been operated. Adequate uptake of ICG in 13 patients, the case that did not uptake had thickened walls and it was not possible to inject ICG properly the day before. 5 patients(35%) had received neoadjuvant treatment. All patients were operated by laparoscopy, performing 9 subtotal gastrectomy(65%), Roux Y reconstruction in 7 cases and Billroth I reconstruction in 2 cases, 5 total gastrectomy(35%) with Roux Y reconstruction, in all cases D2 lymphadenectomy was performed. In 11 cases(78%) the ICG was used to extend the dissection to other areas with fluorescence, without complications or morbidity associated with the enlargement of the dissection. In 2 cases(14%) it was used to delimit the lymphadenectomy area and avoid going into unsupported territories where access was not necessary. Results show absence of metastasis in all the LN with uptake that we studied separately.
Conclusions: LM using ICG has a key role in intraoperative identification of the tumor-dependent lymphatics, allowing complete excision with minimal dissection of adjacent structures, but also it serves to not leave unresected LN that have captured the ICG without added morbidity associated with it in case of directed dissection thanks to fluorescence.
Upper GI—gastric cancer
P245—Sarcopenia and pre-operative nutritional status in gastrectomized patients for cancer: a retrospective monocentric study
Gabriele Luciano Petracca, G Dalmonte, M Valente, I Rausa, M Maggio, F Marchesi
University Hospital of Parma, Medicine and Surgery, Italy
Aims: Since 2010, the European Working Group on Sarcopenia in Elderly (EWGSOP) established the definition of sarcopenia and the guidelines for its diagnosis.
The so-called “frailty” represents a very important predictor of postoperative outcomes in cancer patients, however what is the optimal fragility parameter is not clear. Sarcopenia is a condition closely related to frailty and could be an important prognostic factor to be considered for the management and treatment of these patients.
The purpose of our study is to confirm the scientific evidence, evaluating the impact of sarcopenia on short and long-term outcomes in patients undergoing gastrectomy in our operating unit.
Methods: A non-profit retrospective observational study was conducted on 174 patients who performed total gastrectomy. Data relating to surgery, preoperative examinations, comorbidities, histological characteristics of the tumor were collected. The assessment of sarcopenia was performed using the L3-Skeletal Muscle Index (L3-SMI) using the specific criteria published by Prado et al. obtained through the study of preoperative abdomen CT images.
The population was divided into two groups (Sarcopenia YES, Sarcopenia NO) which were compared for preoperative variables and histopathological characteristics of the tumor. In addition, survival and disease-free interval analyzes were performed for both groups (up to 120 months).
Results: The results obtained showed a significant correlation between sarcopenia and comorbidities (p = 0,003), hypoalbuminemia (p = 0,015), anemia (p = 0,005), iron deficiency (p = 0,013), lymph node metastasis (p = 0,025), stage more than the second (8th edition AJCC) (p = 0,045). The survival study showed that sarcopenia is a dependent factor on overall survival (OS) up to 120 months associated with anemia (p = 0,005) and iron deficiency (p = 0,037). The result demonstrated that sarcopenia is associated with worse OS in stage 0-II (p = 0,041).
Conclusion: Our study confirms the potential of the clinical use of sarcopenia as a prognostic factor for the clinical outcome in the medium to long term in patients undergoing total gastrectomy. The pre-operative abdomen CT should be used for advanced lymph node study (radiomics) for direct the patient to the most appropriate therapeutic path before undergoing surgery.
Upper GI—gastric cancer
P246—A comparison of submucosal versus subseroal approach towards optimized indocyanine green tracer-guided laparoscopic lymphadenectomy for gastric cancer
Qing Zhong, C Chen, h Xiao-Bo, h Chang-Ming
Fujian Medical University Union Hospital, Department of Gastric Surgery, China
Background: The application of indocyanine green (ICG) imaging has been shown to be effective in guiding radical lymphadenectomy for gastric cancer. However, the optimal approach of ICG injection remains controversial. The aim of this study was to compare the efficacy of the submucosal approach (SMA) and subserosal approach (SSA) of ICG injection for lymph node (LN) tracing during radical gastrectomy in patients with gastric cancer.
Methods: Patients with potentially resectable gastric adenocarcinoma (clinical tumor stage cT1-cT4a, N0/ + , M0) were enrolled in a prospective randomized clinical trial (ClinicalTrials.gov, NCT04219332) at a tertiary referral teaching hospital between December 2019 to October 2020. The number of retrieved LNs, rate of LN noncompliance, postoperative complications, and postoperative recovery data were compared between the groups in a modified intention-to-treat analysis.
Results: A total of 266 patients were randomized to either the SMA group (133 patients) or the SSA group (133 patients). After postsurgical exclusions, 259 patients were included in the modified intention-to-treat analysis, which comprised 130 patients (87 men and 43 women; mean [SD] age, 58.8 [11.3] years) in the SMA group and 129 patients (88 men and 41 women; mean [SD] age, 59.0 [10.3] years) in the SSA group. The baseline characteristics of the two groups were balanced (P > 0.05). The mean total number of LNs retrieved was 49.8 [14.6] in the SMA group and 49.2 [14.0] in the SSA group with no significant difference (P = 0.713). A stratified analysis by surgical procedure showed that the mean total lymph node dissection in the SMA group was comparable to that in the SSA group (P > 0.05 for both distal gastrectomy and total gastrectomy). And the number of perigastric LN and extraperigastric LN retrieved in the SMA group was comparable to that in the SSA group (P > 0.05 for both). The rate of LN noncompliance in the SMA group was comparable to that in the SSA group (32.3% vs. 33.3%, P = 0.86). The postoperative recovery process was comparable, and no significant difference was found between the SMA and SSA groups in the incidence (23 of 130 patients [17.7%] vs 21 of 129 [16.3%], respectively; P = 0.762) or severity of complications (P = 0.850) within 30 days after surgery.
Conclusions: This RCT study confirms that subserosal injection of ICG is not inferior to submucosal injection of ICG in terms of LN tracing.
Upper GI—gastric cancer
P248—Influence of laparoscopic approach on positive margins after gastrectomy for gastric cancer
Luz Juez, Pablo Priego, V. Vaello, R. Arranz, A. G. Barranquero, J. Galindo, J.M. Fernández Cebrián
Ramon y Cajal University Hospital, General Division, Spain
Introduction: Nowadays, surgical resection is the only possible cure for gastric cancer (GC), especially at early stages of the disease. The most important goal of surgery is to achieve a complete resection with negative margins (R0). However, positive surgical margins are frequently found in clinical practice, with an incidence that range from 1 to 20%. The feasibility and safety of laparoscopic gastrectomy for the treatment has been reported by many studies. Nevertheless, tactile feedback is limited in laparoscopic surgery, and it remains difficult to assess the site of the tumour during surgery and to determine a safe resection margin. The aim of this study was to evaluate the influence of laparoscopic approach in positive margins after gastrectomy for stomach cancer.
Materials and methods: A total of 241 patients who underwent gastrectomy with curative intent between January 2010 and December 2018 in our center were enrolled in this study. Postoperative histological analysis revealed positive resection margins in 18 patients (7,5%). Clinical-pathological characteristics and post-surgical outcomes of patients undergoing laparoscopic gastrectomy were analyzed. The influence of the laparoscopic approach and the negative and positive margins were also compared.
Results: Patients’ and tumours’ characteristics were listed in Table 1. Laparoscopic approach was selected in 25% of the sample (61 patients). In univariate analysis, no statistically significant differences have been found between the choice of approach and post-surgical complications (p = 0,956) as well as the median number of nodes in the surgical specimen (0,587).
No statistically significant differences have been found between the open/laparoscopic approach and the presence of affected margins in the surgical specimens (open 7% vs laparoscopic 9,8%; p = 0,407). However, patients with positive margins were associated with higher American Joint Committee on Cancer (AJCC) (p = 0,003), median number of positive nodes (p = 0,021), diffuse Lauren type (p = 0,026), whole stomach affected (p = 0,001) and higher morbidity (0,045).
Binary logistic regression model, once adjusted by laparoscopic approach, tumour location, Lauren type, AJCC stage and median lymph nodes involved, demonstrated that only the median of nodes affected was independent prognostic factor associated to positive margins (OR: 1.064 CI [1.022- 1.11]).
Conclusion: Our results suggest that laparoscopic gastrectomy is a safe and feasible technique for the treatment of gastric cancer and that the presence of affected margins is not influenced by the laparoscopic approach but by the advanced state of the disease.
Table 1: Patients’ and tumours’ characteristics.
| Negative margin n = 223 |
Positive margin n = 18 |
Overall N = 241 |
p-value | ||
|---|---|---|---|---|---|
| n (%) Mean (SD) |
n (%) Mean (SD) |
n (%) Mean (SD) |
|||
| Sex |
Male Female |
136 (61%) 87 (39%) |
7 (61%) 11 (39%) |
147 (61%) 94 (39%) |
1 |
| Age (years) | 73 ± 11 | 71 ± 11 | 72.36 ± 11 | 0.456 | |
| ASA | I | 13 (6%) | 2 (11%) | 15 (6%) | 0.574 |
| II | 119 (53%) | 7 (39%) | 126 (52%) | ||
| III | 89 (40%) | 9 (50%) | 98 (41%) | ||
| IV | 2 (1%) | - | 2 (1%) | ||
| Tumour location | GE junction | 25 (11%) | 2 (11%) | 27 (11%) | 0.001 |
| Proximal | 5 (2%) | 1 (6%) | 6 (3%) | ||
| Body | 62 (28%) | 5 (28%) | 67 (28%) | ||
| Antrum | 112 (50%) | 6 (33%) | 118 (49%) | ||
| Pylorus | 8 (4%) | 1 (5%) | 9 (4%) | ||
| Anastomosis | 9 (4%) | – | 9 (3%) | ||
| Whole stomach | 2 (1%) | 3 (17%) | 5 (2%) | ||
| Lauren type | Intestinal | 131 (59%) | 5 (28%) | 136 (56%) | 0.026 |
| Diffuse | 60 (27%) | 11 (61%) | 71 (30%) | ||
| Mucinous | 4 (2%) | – | 4 (2%) | ||
| Mixed | 15 (6%) | 1 (6%) | 16 (6%) | ||
| Unknown | 13 (6%) | 1 (5%) | 14 (6%) | ||
| AJCC staging | 0 | 5 (2%) | – | 5 (2%) | 0.003 |
| I | 60 (27%) | 1 (6%) | 61 (25%) | ||
| II | 91 (41%) | 4 (22%) | 95 (40%) | ||
| III | 67 (39%) | 13 (72%) | 80 (33%) | ||
| Type of gastrectomy | Proximal | 1 (1%) | – | 1 (1%) | 0.703 |
| Distal subtotal | 105 (47%) | 6 (33%) | 111 (46%) | ||
| Total | 106 (47%) | 11 (61%) | 117 (48%) | ||
| Total gastrectomy of the remanent | 11 (5%) | 1 (6%) | 12 (5%) | ||
| Laparoscopic approach | 55 (25%) | 6 (33%) | 61 (25%) | 0.407 | |
| Lymph node dissection | D1 | 26 (12%) | 3 (17%) | 29 (12%) | 0.400 |
| D1+ | 27 (12%) | 4 (22%) | 31 (13%) | ||
| D2 | 101 (45%) | 4 (22%) | 105 (43%) | ||
| D2+ | 30 (14%) | 3 (17%) | 33 (14%) | ||
| Unknown | 39 (17%) | 4 (22%) | 43 (18%) | ||
| Lymph nodes involved | 1 (0–4) | 7.5 (0.75 – 15.75) | 1 (0–5) | 0.021 | |
| Lymph nodes removed | 22 (15–32) | 25.5 (14.75- 34.75) | 23 (15–32) | 0.599 | |
| Morbidity | 90 (40%) | 12 (67%) | 102 (42%) | 0.045 | |
| Postoperative complications (according to Clavien-Dindo classification) [28] | I | 10 (13%) | 1 (8%) | 11 (12%) | 0.066 |
| II | 35 (44%) | 5 (42%) | 40 (44%) | ||
| III | 27 (34%) | 6 (50%) | 33 (36%) | ||
| IV | 7 (9%) | – | 7 (8%) | ||
| V | |||||
| Postoperative mortality | 11 (5%) | 0% | 11 (5%) | 1 | |
ASA (American Surgical Association); AJCC staging (American Joint Committee on Cancer staging); IQR (Interquartile Range);
Upper GI—gastric cancer
P249—Surgical outcomes, technical performance and surgery burden of robotic total gastrectomy for locally advanced gastric cancer: a prospective study
Qing Zhong, M. Lin, Q.-Z. Qiu, Q.-Y. Chen, J.-W. Xie, C.-M. Huang
Fujian Medical University Union Hospital, Department of Gastric Surgery, China
Aims: The impact of robotic systems on surgical performance and clinical outcomes after total gastrectomy remains obscure. This study was conducted to compare the short-term outcomes, surgery burden, and technical performance of robotic total gastrectomy (RTG) and laparoscopic total gastrectomy (LTG) for gastric cancer (GC).
Methods: This prospective study (FUGES-014 study) included 50 patients with locally advanced proximal GC (cT2-cT4a, N0/ + , M0) who underwent RTG at a tertiary referral hospital between March 2018 and February 2020 (ClinicalTrials.gov, NCT03524287). To compare the outcomes between RTG and LTG, patients who underwent LTG in the FUGES-002 study (ClinicalTrials.gov, NCT02333721) were also enrolled. The primary outcomes were postoperative complications. The Objective Structured Assessment of Technical Skills (OSATS) and the Generic Error Rating Tool were used to evaluate technical performance.
Results: After propensity score matching, 48 patients in the RTG group and 96 patients in the LTG group were included in the analysis. The RTG group had a lower volume of intraoperative blood loss than the LTG group (66.4 vs. 38.7 mL, P = 0.042). The mean numbers of LNs retrieved in the RTG and LTG groups were 47.9 and 44.0, respectively. Significantly more extraperigastric lymph nodes were retrieved in the RTG group than in the LTG group (20.2 vs. 17.5, P = 0.039). The major noncompliance rate of the RTG group was significantly lower than that of the LTG group (27.1% vs. 45.8%, P = 0.030). The average number of errors was lower in the RTG group than in the LTG group (43.2 vs. 53.8 times/case, P < 0.001). The RTG group had a higher technical skill score (30.2 vs. 28.4, P < 0.001) and a lower surgery task load index (33.2 vs. 39.8, P < 0.001) than the LTG group (Fig. 1). No significant difference was found in terms of postoperative morbidity between the two groups (14.6% vs. 16.7%, P = 0.748).
Conclusions: In complex total gastrectomy for GC, compared with traditional laparoscopic surgery, robotic surgery provides a technically superior operative environment and reduces surgeon workload, which is reciprocal for surgeons and patients.
Upper GI—gastric cancer
P330—Oncological outcomes of laparoscopic versus open gastrectomy after neoadjuvant chemotherapy for locally advanced gastric cancer: a retrospective multicenter study
Islam khaled Ahmed1, Dr Ahmed2
1Faculty of Medicine—Suez Canal University, Surgical oncology, 2National cancer Institute- Cairo University, Surgical oncology, Egypt
Background: The oncological outcomes of laparoscopic gastrectomy (LG) and open gastrectomy (OG) following neoadjuvant chemotherapy have been investigated in a few studies. Our purpose was to evaluate the oncological outcomes of LG and OG after neoadjuvant chemotherapy in patients with locally advanced gastric cancer (GC) and to determine the advantages, preferences, and ease of use of the two techniques after chemotherapy.
Methods: We conducted a retrospective chart review of all patients who underwent either OG (n = 43) or LG (n = 41). The neoadjuvant treatment regimen consisted of capecitabine plus oxaliplatin for three cycles, which was then repeated 6 to 12 weeks after the operation for four cycles.
Results: The hospital stay time and intraoperative blood loss in the LG group were significantly lower than those in the OG group. The mortality rate and the 3-year survival rate for patients in the LG group were comparable to those of patients in the OG group (4.6% vs. 9.7% and 68.3% vs. 58.1%, respectively). Similar trends were observed regarding the 3-year recurrence rate and metastasis. The mean survival time was 52.9 months (95% confidence interval [CI], 44.2–61.6) in the OG group compared with 43.3 (95% CI, 36.6–49.8) in the LG group. Likewise, the mean disease-free survival was 56.1 months (95% CI, 46.36–65.8) in the LG group compared with 50.9 months (95% CI, 44.6–57.2) in the OG group.
Conclusion: LG is a feasible and safe alternative to OG for patients with locally advanced GC receiving neoadjuvant chemotherapy.
Upper GI—gastric cancer
P345—Effect of preoperative tumour under-staging on the long-term survival of patients undergoing radical gastrectomy for gastric cancer
Mi Lin, Q.Y. Chen, Q. Zhong, C.M. Huang, P. Li
Fujian Medical University Union Hospital, Department of Gastric Surgery, Fuzhou, China
Purpose: This study aimed to evaluate the effect of preoperative tumour staging deviation (PTSD) on the long-term survival of patients undergoing radical gastrectomy for gastric cancer (RGGC).
Methods: Clinicopathological data of 2 346 patients who underwent RGGC were retrospectively analysed. The preoperative tumour-lymph node-metastasis (TNM) under-staging group (uTNM) comprised patients who had earlier preoperative TNM than postoperative TNM, and the no preoperative under-staging group (nTNM) comprised the remaining patients.
Results: There were 1 031 uTNM (44.0%) and 1 315 nTNM cases (56.0%). Cox prognostic analysis revealed that PTSD independently affected the overall survival (OS) after surgery. The 5-year OS was lower in the uTNM group (41.8%) than in the nTNM group (71.6%). Analysis of surgical and pathological factors showed that among patients with pT2, pT3 + 4, and pN + , all patients in group nTNM underwent D2 lymph node dissection (LND), whereas 15.1%, 1.3%, and 5.5% patients in group uTNM underwent D1 + LND, respectively. Among patients with pN0, the lymph node noncompliance rate was higher in the uTNM than in the nTNM group. Logistic analyses revealed that high BMI, tumour size < 2 cm, early gross typing, and differentiated tumours in the upper stomach independently affected uTNM (P < 0.05).
Conclusion: Underestimated tumour staging is not rare, which possibly results in inadequate LND and affects the long-term survival for patients undergoing RGGC. D2 LND should be carefully performed in patients who are predisposed to this underestimation.
Upper GI—gastroduodenal diseases
P251—Analysis of gastrointestinal perforations in an emergency surgery unit
Alberto Reyes, B. Marenco De La Cuadra, Reguera Rosal, M. Infantes Ormad, M. Retamar Gentil, J. Valdes Hernandez, F. Oliva Mompean, J.A. López Ruiz
Virgen Macarena University Hospital, General Surgery, Spain
Aim: The main aim was to analyze the outcomes in patients operated for a gastroduodenal perforation from January 2015 to June 2020.
Methods: This is a retrospective observational study that included 96 patients who underwent emergency surgery for a gastroduodenal perforation.
The variables analyzed in this study were the type of approach, the length of hospital stay, and the postoperative complications, as well as the rate of intra-abdominal collections, the ASA classification, the conversion and reoperation rate, and the mortality rate.
Outcomes: A total of 96 patients (33% women, 67% men) with a median age of 53 years were registered. 73% of the patients were smokers and 21% had a recent history of NSAID use.
The surgical approach was open in 49 cases (51%) and laparoscopic in 46 (49%), being the most used surgical technique the simple closure with epiploplasty.
Analyzing it for years, we find a progressive increase in the use of laparoscopy, with only 4.3% of patients being resolved by laparoscopy in 2015, while 94% and 75% were operated by laparoscopy in 2019 and 2020 respectively,
An open approach was chosen in 54% of ASA III patients and 83% of ASA IV patients.
31% of the patients operated by open surgery developed an intra-abdominal abscess in the postoperative period, compared to 21% of the patients operated by the laparoscopic approach, which was not statistically significant.
In 5 of the patients operated by the open approach (10%) a reoperation was necessary (due to: pyloric stenosis, suture dehiscence, and compartment syndrome, among others) compared to 4 of the laparoscopic cases (8%) (stenosis of the pylorus, suture dehiscence, compartment syndrome and inadvertent perforation of the gallbladder), not being statistically significant.
17% of the patients (8 patients) operated laparoscopically required conversion, 3 of them because perforation was not observed, 3 due to adherence syndrome, one for technical difficulties, and another for bleeding secundary to liver decapsulation.
The median hospital stay was 7 days. 58% of the patients with a laparoscopic approach were discharged in the first 5 days, compared to 42% with an open approach.
In the case of the open approach, 70% of the patients required a hospital stay longer than 8 days, compared to 30% of the patients operated by laparoscopy, being this result statistically significant.
Mortality was thirteen cases, eleven of them (85%) belonging to the open surgery group, compared to the two cases (15%) of the laparoscopic group, finding statistically significant differences.
In an evaluation of mortality between open and laparoscopic approach grouped according to ASA, it was observed: in ASA I there was no deaths, in ASA II and ASA III mortality was not statistically significant between the two groups, while in ASA IV we found statistically significant differences. However, this is due to the fact that all ASA IV patients were operated by open surgery because of the patient's instability.
Conclusion: The laparoscopic approach in gastroduodenal perforation is a safe and effective method for the treatment of this pathology, with a shorter hospital stay.
Upper GI—gastroduodenal diseases
P252—A rare case of adult jejunal intussusception caused by subserosal lipoma
Vlad-Costin Ilie, C.E. Minciuna, M Lacatus
Fundeni Clinical Institute, General Surgery, Romania
Intussusception is more common in children than it is in adults, so it can be challenging to recognize it as an etiology for recurrent abdominal pain and intermittent bowel obstruction, the symptoms being unspecific. Intussusceptions can be primary (idiopathic), when the mechanism is unknown, or secondary, when there is a pathologic lesion of the bowel wall such as benign/malignant tumors or metastatic neoplasms, inflammatory bowel disease, postoperative adhesions, Meckel’s diverticulum, or even iatrogenic (intestinal tubes, jejunostomy feeding tube). Malignancy (adenocarcinoma) accounts for up to 66% of cases of intussusception occurring in the large intestine, but only 30% in the small intestine, where benign lesions are more common.
This report presents the case of a 62-years-old female patient admitted in our department for diffuse abdominal pain and recurrent subocclusive episodes, with a contrast enhanced pelvic MRI that revealed a classic appearance of jejunal intussusception which appeared to be caused by a well-defined tumor, suggestive of a lipoma. The laparoscopic approach was chosen, revealing the jejuno-jejunal intussusception caused by a 2/2 cm subserosal lipoma, which was successfully managed with segmental intestinal resection, the patient being discharged 3 days after the intervention.

Upper GI—gastroduodenal diseases
P253—Minimizing in minimally invasive surgery through the use of a novel and flexible super elastic titanium needle suitable for a 3.5 and 5 mm trocar
Samir Delibegovic
University Clinical Center Tuzla, Surgery, Bosnia-Herzegovina
The use of smaller ports in surgery is the next step in the evolution of minimally invasive procedures. We present findings, using a novel flexible needle made from a super elastic titanium alloy, which demonstrate that it is possible for a 26- and 30-mm needle to pass through a 3.5 and 5 mm trocar. This new approach results in less trauma and improved cosmetic effect in comparison to the classical 10 mm port.
Traditional steps such as handling of the needle holders, loading the needle and placing it at the correct angle and direction, inserting the needle into the tissue, and finally safely tying a knot remain the same as with the standard procedure. We propose that this improved type of needle creates a refinement opportunity to replace the classic ones during both, laparoscopic and robotic surgeries.

Upper GI—gastroduodenal diseases
P254—Experimental evaluation of changes in mucosal superoxide dismutase after local PRP injection in rats with gastric ulcers and hemorrhagic shock
Viktoriia Petrushenko1, D.I. Grebeniuk1, I.V. Taran2, V.S. Sobko1, N.A. Liakhovchenko1
National Pirogov Memorial Medical University, 1Department of Endoscopic and Cardiovascular Surgery, 2Department of Pharmacology, Vinnytsya, Ukraine
The aim of the study was to evaluate changes in mucosal Superoxide Dismutase (SOD) after local PRP injection in rats with gastric ulcers and hemorrhagic shock in experiment.
Methods: The study was performed on 91 Wistar rats (average weight of animals was 183 ± 16 g) according to local and international rules for working with experimental animals. We randomly divide all animals in 5 groups: Control Group (n = 7) – intact animals; Comparison Group (n = 21) – gastric ulcer; Group 1 (n = 21) – gastric ulcer + hemorrhagic shock; Group 2 (n = 21) – gastric ulcer + hemorrhagic shock + local injection of 0.1 ml of 0,9% sodium chloride; Group 3 (n = 21) – gastric ulcer + hemorrhagic shock + local injection of 0.1 ml platelet-rich plasma (PRP).
Gastric ulcers were modeled using our modification of type 2 acetic acid ulcer model (Susumu Okabe, 2005). Hemorrhagic shock was modeled by 3–3.5 ml blood sampling. On 1st, 7th and 14th day measurement of mucosal SOD levels were performed.
Results: In all groups and on all control days of the study, SOD activity levels were lower than in the control group.
On day 1, SOD activity in Groups 1, 2, 3 were significantly lower (p < 0.05) than in the Comparison Group. Moreover, the indices in the Groups 1, 2, 3 didn’t significantly differ from each other (p > 0.05).
On day 7 of the study, we didn’t reveal a significant difference in the level of the studied indicator between the Comparison Group and Group 3 (p < 0.05), as well as between Groups 1 and 2 (p > 0.05). Moreover, in pairwise statistical comparison, the indicators in the Comparison Group and Group 3 were statistically significantly higher than the similar levels in Groups 1 and 2 (p < 0.05).
On the day 14, levels of the enzyme activity in Group 3 were significantly higher than levels in all other groups (p < 0.05) and approached the indices of the control group.
Conclusions: Local PRP injection in rats with gastric ulcers and hemorrhagic shock allows to reduce oxidative stress in the periulcellular zone.
Upper GI—gastroduodenal diseases
P255—Nurses' role in endoscopic surgery clinics during the SARS COVID-19 pandemic
Aferdita Ademi
Clinical Hospital, General Surgery, North Macedonia
The Covid-19 pandemic has reached immense proportions globally, affecting nations and all aspects of economic and social life in all age groups and social strata without exception. Nevertheless, doctors and other medical staff are bearing the heaviest load as the first in the line of defense with this unprecedented situation. We have witnessed that nurses are generally the most active and most endangered group in health services when confronting the pandemic challenges and their consequences. Their role is irreplaceable in the treatment of patients in all hospital clinics. Even in minimally invasive surgery clinics, nurses' role is critical not only in organizing the work and maintaining the protective measures against the pandemic but also in the post-operative care of patients operated on with endoscopic procedures.
Aim of the study: The purpose of this presentation is to show the problems, responsibilities, and risks faced by nurses in endoscopic surgery wards after the SARS Covid-19 epidemic.
Material and Methods: In the period May—October 2020, in the Clinic of General Surgery—Department of Endoscopic Surgery of the Clinical Hospital of Tetova, were operated 39 patients with laparoscopic interventions. After hospitalization, some of those patients were diagnosed with Covid-19 infection. Such cases are always alarming and encourage the mobilization of all medical staff of the Clinic to strengthen protective measures, including the isolation of patients in special rooms and the discontinuance of their families' visits.
Results: Out of 39 patients operated on during this time in the Surgery Clinic of the Clinical Hospital of Tetova, 22 were female while 17 were male. The age of the operated patients ranged from 21 to 74 years. On the day of hospitalization, all patients stated that they had no contact with infected persons, while their PCR tests were negative. But beyond this, in four patients on the second or third day after hospitalization, the typical symptoms for Covid 19 began to be apparent. At the same time, the repetition of the PCR—test resulted in positive. Such patients were isolated immediately in separate rooms while the hospital's sanitary services disinfected the entire ward. The nurses who took care of these patients in the post-operative period respected all protective measures and took care that the patients strictly by adhering to all recommendations to prevent the virus's spread.
Conclusion: In this time of the pandemic, nurses are the most endangered part of the medical staff even in the Endoscopic Surgery Clinics, and in return, they must be well informed about the SARS Covid-19 virus, to have the skills to manage with the newly created circumstances, to know well the procedures of decontamination and isolation, and often to provide psychological support to infected patients, as well as to diagnose as soon as possible the concerns that arise in infected patients.
Upper GI—gastroduodenal diseases
P256—Tranexamic acid in upper GI bleeding, is there a role? A systematic review and meta-analysis
Eoghan Burke
St Lukes Kilkenny, Surgery, Ireland
Introduction: Upper Gastrointestinal bleeding is associated with increased morbidity and mortality. It has been suggested that tranexamic acid (TXA) may be useful in arresting bleeding.
Aim: To synthesise available evidence of the effect of TXA on upper GI bleeding.
Methods: A systematic review was conducted. PubMed, EMBASE and Cochrane central register of controlled trials were searched for relevant studies. A random effects meta-analysis was performed to determine the risk ratio of primary and secondary outcomes.
Results: 8 studies were included in the review. Total number of patients included was 12,994 including 4550 females (35%). The effect of TXA on mortality: risk ratio was 0.95 which favoured TXA however the 95% CI ranged from 0.80 to 1.13 and was not statistically significant. The re-bleeding rate risk ratio was 0.64, which favoured the TXA group and with a 95% CI ranging from 0.47 to 0.86 this was statistically significant. The risk of adverse thromboembolic events: risk ratio was 0.93 favoured the TXA group however the 95% CI extended from 0.62 to 1.39 and so was not statistically significant.
Conclusion: We cannot recommend the routine use of TXA in the setting of acute upper GI bleeding outside its use in randomised controlled clinical trials.
Upper GI—gastroduodenal diseases
P259—Hairy situation’: an unusual cause of weight loss in a young female
Junaid Naqeeb, D,R. Aherne, M. Cunningham
University Hospital Limerick, Dooradoyle, Limerick, Department of General Surgery, Ireland
Background: Bezoars are intraluminal masses in the gastrointestinal tract composed of indigestible food or fibers, with trichobezoars comprising a mass of hair. First identified in humans by Baudomant in 1779, they are most commonly found in the stomach. Classically they occur in children and young females, particularly those with underlying psychiatric conditions including trichotillomania (a disorder characterized by hair pulling from the scalp, eyebrows, eyelashes or other body parts). We present an interesting case of a massive trichobezoar in a young female.
Methods: A 21-year-old female presented with intermittent gastric outlet obstruction-type symptoms, accompanied with approximately two stone weight loss over the past year. She admitted to a history of trichophagia between the ages of 14 and 17. Blood count revealed a haemoglobin of 7, with CT abdomen revealing a large mixed-attenuation mass in the stomach. Trichobezoar was confirmed on upper endoscopy.
After informed written consent, upper midline laparotomy was performed and trichobezoar was removed en-bloc from the stomach via longitudinal gastrotomy. The specimen weighed 875 g. The stomach was closed in layers with absorbable suture.
Results: Patient had uneventful post-op recovery. A psychiatric evaluation and dietician review was arranged postoperatively and she was discharged one week later with planned surgical and psychiatric follow-up.
Conclusions: Trichobezoars are late complications of trichotillomania and trichophagia. Underlying mental health issues including obsessive compulsive disorder and body dysmorphic disorder are common and psychiatric evaluation is key. Surgical removal is the only option for large bezoars with their size determining laparoscopic vs open approach.
Keywords: Trichobezoar, Psychiatric, Case report.
Upper GI—gastroduodenal diseases
P260—Minimally invasive method of treatment of the duodenal fistula
Oleksandr Usenko1, Ya. Voitiv1, O. Tyvonchuk1, I. Tereshkevich2
Shalimov National Institute of Surgery and Transplantology, 1Department of Toracoabdominal Surgery, 2Laboratory of Interventional Endoscopy, Ukraine
Aims: To improve the results of treatment in patients with duodenal fistula.
Methods: The object of the retro- and prospective study were 17 patients with failure of the duodenal sutures and duodenal fistulas, who were treated at the Shalimov National institute of Surgery and Transplantology from 2016 to 2020. All patients performed a complex examination that included general clinical, laboratory and special instrumental methods.
Results: Miniinvasive endoscopic method for the treatment of the duodenal sutures insufficiency was elaborated with a patent obtaining, which consists of endoscopic placement of a covered nitinol self-expanding stent into the defect zone. In presence of the complication, constituting a duodenal fistula, there was proposed to place a covered nitinol self-expanding stent into the defect zone together with vacuum-therapy from the side of the fistula external aperture (Ukrainian patent for utility model №144554UA). Due to application of the treatment method elaborated, it have become possible to reduce the morbidities quantity and to shorten the patients’ stationary stay by 36%—from (38.1 ± 4.16) to (25.4 ± 3.7) bed-days (p < 0.05). General mortality in the investigated group have constituted 9%, what was in two times lower, than the mortality index in a control group—16%.
Conclusions: The method, investigated by us, have constituted a combined approach with endoscopic placement of a self-expanding stent into the defect zone together with vacuum therapy from the external aperture of fistula, promoting improvement of the treatment results of the duodenal sutures insufficiency, accompanied by shortening of the patients’ stationary stay and reduction of morbidity and mortality.
Upper GI—gastroduodenal diseases
P334—Feasibility of a gastroscopy-guided laparoscopic local resection for duodenal submucosal tumor
Young-Joon Lee1, 2, Y. H. Young-Hye1, J. H. Ji-Ho1
1Gyeongsang National University Changwon Hospital, 2Gyeongsang National University School of Medicine, Surgery, Korea
Purpose: Local resection of submucosal tumors in duodenum is challenging due to the difficulty of fine localization and high risk of causing deformity in duodenal passage. In this study, we evaluated the feasibility and safety of gastroscopy-guided laparoscopic wedge resection (GLWR) for duodenal submucosal tumors to overcome the above difficulties.
Method: A total 11 cases underwent gastroscopy-guided laparoscopic wedge resection (GLWR) for duodenal submucosal tumors at Gyeongsang National University Hospital. During the GLWR procedure, an endoscope was used to provide sufficient dissection around duodenal tumor. Then, the location was confirmed by endoscope, full thickness of wedge resection was performed using a laparoscopy. The clinicopathological characteristics and surgical results were analyzed. These procedures are shown in this paper.
Result: All procedures were successfully performed without requiring a major duodenal resection. The mean operation time was 101 min, estimated blood loss was 15 ml and postoperative hospital stay was 6.8 days. The tumors pathologically consisted of five neuroendocrine tumor (NET), four gastrointestinal stromal tumor (GIST), one heterotrophic pancreas, and one traumatic neuroma.
Conclusion: Gastroscopy-guided laparoscopic wedge resection (GLWR) is a feasible and safe treatment option for duodenal submucosal tumors, as reliable minimal invasive procedure to avoid duodenal deformity through fine localization.
Upper GI—Reflux-Achalasia
P261—Laparoscopic bio-a mesh-augmentation Crura repair of paraesophageal hiatal hernia: 5- YEARS results
Carlos Hoyuela1, S. Guillaumes2, N.J. Hidalgo2, M. Juvany3
1Hospital de Mollet, General and Digestive surgery, 2Hospital Clinic Barcelona, Gastrointestinal surgery, 3Hospital de Granollers, Surgery, Spain
Introduction: All symptomatic paraesophageal hiatal hernias should be repaired, particularly those with acute obstructive symptoms or those who have undergone volvulus (Sages Guidelines).
Mesh augmentation repair reduces the recurrence rate but can lead to severe complications. To use of absorbable mesh has been associated with lesser side effects, but the long-term safety and effectiveness are still debated.
Objective: To prospectively assess the safety, postoperative morbimortality, and recurrence rate of laparoscopic mesh-augmentation repair of paraesophageal hiatal hernia using a synthetic absorbable mesh after 5-years of follow-up.
Methods: 32 patients (26 women/6 men) suffering from a paraesophageal hiatal hernia underwent a laparoscopic mesh-augmentation repair of the crura plus fundoplication. Patients in whom crura could not be closed were excluded. The mean age was 67,1 ± 11 years. ASA status I-II: 75%; ASA status III-IV: 25%. Max /min defect measure: 8 × 5 / 5 × 4 cm.
Results: All procedures were performed laparoscopically without conversions. The operating time was 119 ± 30 (75–180) minutes. Hospital stay: 2 ± 1,4 (1–7) days. No mesh-related complications nor mortality were observed. Postop dysphagia rate: 6% (2 patients), but solved soon. Mean follow-up: 54,5 (13–110) months. Three patients (9%) developed recurrence (28, 32, and 38 months of follow-up).
Conclusions: Crura augmentation with Bio-A- mesh for laparoscopic repair of mild paraesophageal hiatal hernias is safe and it was not related to long-term complications. 9% mid-term recurrence rate seems to be acceptable.
Upper GI—Reflux-Achalasia
P262—Lessons learnt and learning curve of anti-reflux procedures: a retrospective analysis of a single-surgeon series
Luke Taylor1, S Patel2, S Albabkainy1, R Barnett3, A Rasheed1
1Royal Gwent Hospital, Department of Upper GI Surgery, 2Cardiff University, Cardiff University Medical School, 3University Hospital of Wales, Department of Upper GI Surgery, United Kingdom
Aims: Gastro-oesophageal reflux disease (GORD) is a common complaint in the UK, with a prevalence of ~ 10%. Surgical treatment for GORD is has become increasingly popular to improve quality of life and reduce associated risks of long-term acid exposure or PPI use. Surgical outcomes are variable in their success and complication rate. In this study we aim to analyse how to best identify appropriate patients to the optimal technique of anti-reflux surgery.
Methods: A retrospective review was performed of 234 consecutive patients who underwent primary laparoscopic anti-reflux surgery (LAS) under a single surgeon (May 2006- Sept 2020). The electronic medical record was interrogated to collect data including pre-operative assessment, peri-operative details including duration of operation, operation performed, length of stay and outcomes. JMP statistical software was used to carry out Logistical Regression and Mann–Whitney U testing of the dataset variables.
Results: 216 (92%) of patients had confirmed hiatal hernia on pre-operative investigations. The majority (68.5%) were type I hernias. 50% patients had a DeMeester score > 14. 142 patients (60.4%) completed oesophageal manometry, and 72.3% had a barium swallow. The average length of stay was 3 days. 22 patients (9.4%) subsequently had re-do surgery.
Conclusions: LAS is a complex surgical procedure that encompasses a steep learning curve, both in surgical technique and patient selection. Peri-operative investigations to determine the severity of GORD as well as the presence and type of hiatal hernia, are crucial for selection of appropriate patients, choice of technique and good operative outcomes.
Upper GI—Reflux-Achalasia
P263—The results of antireflux operations in the treatment of patients with hiatal hernia
Shevchenko B., Babii O., Prolom N
Oleksandr Babii, B.F. Shevchenko, N.V. Prolom
SI “Institute of Gastroenterology of NAMS of Ukraine”, Department of surgery of digestive organs, Dnipro Ukraine
Aim: To evaluate the results of antireflux operations in the treatment of patients with hiatal hernia.
Material and methods: 134 patients with hiatal hernia got surgical treatment with laparoscopic access in the department of surgery of digestive organs of SI “Institute of Gastroenterology NAMS of Ukraine” for the period january 2013 – march 2021. Males were 56 (41.8%), females – 78 (58.2%), aged 21–70 (36.5 ± 4.2) years. In patients there were diagnosed hiatal hernias: type I – 109 (81.3%), type II – 20 (15.0%) and type III – 5 (3.7%) patients.
Results: Cruroplasty were performed 100.0% patients: posterior – 67 (50.0%), anterior and posterior (combined) – 36 (26.8%), alloplasty cruroplasty – 16 (11.9%) patients. We used the following options of laparoscopic fundoplication in patients with hiatal hernia: Nissen fundoplication – 96 (71.6%), Toupet fundoplication – 12 (8.9%) and Dor fundoplication – 11 (8.2%) patients. Fundodiaphragmopexia were performed in 87 (64.9%) patients. In the modification of the clinic of the institute, which is aimed at correcting of the failure of the physiological cardia with preservation of the ligamentous apparatus of the stomach, the anatomical relationship of the diaphragm and the zone of the esophageal-gastric junction, includes cardiocruroplasty and transverse cardiogastroplication with diaphragmopexia, 15 (11.2%) patients were operated.
When performing Nissen, Dor, Toupet complications were noted in 20 (14.9%) cases: intraoperative (bleeding, pneumothorax, emphysema) – 8 (5.9%), postoperative (pylorospasm, pneumonia, pneumomediastinum, dysphagia, gas-bloat syndrome) – 12 (9.0%). When performing the technique in the modification of the clinic, intraoperative complications (emphysema) were noted in 1 (0.7%) case (p < 0.05), postoperative (pneumonia, pylorospasm) – in 2 (1.5%) cases (p < 0.05).
Among 97 (72.4%) of examined patients in the long term from 6 months to 7 years. After performing of antireflux operations recurrence of hiatal hernias noted in 26 (26.8%) cases. After performing Nissen, Dor, Toupet: true recurrence – 13 (13.4%), anatomical – 6 (6.2%), functional – 4 (4.1%) cases. After performing the technique in the modification of the clinic, only anatomical recurrence were noted in 3 (3.1%) cases (p < 0.05).
Conclusions: The known methods of antireflux operations in the treatment of hiatal hernia require improvement. The proposed method for the surgical correction of the failure of the physiological cardia has advantages over the known methods of antireflux surgery.
Upper GI—Reflux-Achalasia
P264—Surgical management of hiatal hernia—a multicentric study
Silviu Daniel Preda1, S. Patrascu1, D. Cartu1, D. Margaritescu1, M. Bica1, V. Bintintan2, D. Cristian3, K. Sapalidis4, M.V. Surlin1
1Craiova Emergency County Hospital, 1st Clinic of Surgery, 2Emergency County Hospital of Cluj-Napoca, 3rd Clinic of Surgery, 3 “Coltea” Hospital Bucharest, Surgery, Romania. 4University General Hospital of Thessaloniki, 3rd Surgery Clinic, Greece
Laparoscopic repair of hiatal hernia is regarded by the international community as the golden standard in the surgical management of hiatal hernia, whereas the role of laparotomy has seen such a decline that it has mostly been eradicated in experienced centers, remaining an option only for the most difficult of cases. The increasingly larger volumes of quality research and development of guidelines have standardized the management of a variety of surgical pathologies. The surgical management of hiatal hernia has seen consensus only in regard to the indication of surgery, whereas the manner in which the hiatus is repaired, and the type of fundoplication is still heavily debated.
A multicentric study was performed, from October 2016 to October 2019 in which patients undergoing surgical treatment for hiatal hernia were included, in the following Clinics: 1st Clinic of Surgery of the Emergency County Hospital of Craiova, Romania; Surgical Clinic of “Coltea” Hospital Bucharest, Romania; 3rd Clinic of Surgery of Emergency County Hospital of Cluj-Napoca, Romania; and 3rd Surgery Clinic of University General Hospital of Thessaloniki, Greece.
We identified 77 patients with hiatal hernia who underwent surgery in our clinics. The approach was laparoscopic for 73 cases, 1 case of conversion and 3 cases of open approach.
Distribution of demographic data shows a mean age of 60.5 years-old (median age of 61 years-old, minimum of 33, maximum of 88, standard deviation of 11.15 years), male/female ratio of 17/60. Regarding admission, two patients were admitted through emergency setting. Rural/urban ratio was 21/56.
Distribution of data by hernia type revealed 21.8% type I hernia, 3.1% type II hernia, 65.6% type III hernia and 9.3% type IV hernia.
Most frequent, the hiatal hernia was complicated with incarceration in 12.5% of cases. Most frequent intraoperative incident was pleural breach, which occurred in 5 cases. Other intraoperative incidents were: 1 case of gastric tear during manipulation, 1 case of splenic injury (type I) and 1 case of hepatic injury (grade 1). Cruroraphy was performed in all cases. In 13 cases mesh reinforce was added.
Fundoplication was added in 76 cases: 11 Toupet, 65 floppy-Nissen. In one case of type IV hiatal hernia with colonic herniation in a patient with a history of transhiatal esophagectomy with gastric pull-up, no fundoplication was added. Greater curvature of the stomach was mobilized in all but 4 cases. Average operating time was 155.6 min (minimum 60 min, maximum 300 min, standard deviation of 45.4 min).
Postoperative evolution was favorable in all but one case where the patient developed a hemorrhagic stroke in the 2nd postoperative day, patient was transferred to Intensive Care Unit/Neurology Department.
Hiatal hernia requiring surgical correction still remains a rare disease. No consensus exists regarding the best attitude towards recalibrating the esophageal hiatus. Increasingly better intraoperative and postoperative results are being reached through standardization of the surgical technique and improvements of the technological arsenal available.
Upper GI—Reflux-Achalasia
P265—Laparoscopic repair of large hiatal hernia without necessity of Collis gastroplasty: is it a possible option?
Mykola Paranyak1, V Grubnyk2
1Danylo Halytsky Lviv National Medical University, General Surgery, 2Odessa National Medical University, Surgery # 3, Ukraine
Aim: To assess long—term outcomes in patients with large hiatal hernia (HH) who underwent antireflux surgery with extensive mobilization of the esophagus.
Materials and methods: Clinical data was obtained from single—institution prospectively collected database. Between 2014 and 2018, a total of 179 patients with large HH who underwent antireflux surgery were selected. Large HH were considered those with a hiatal surface area larger than 10 cm2. Patients with non-Nissen fundoplications, reoperations were not enrolled in the trial. There were 106 women and 73 men, aged 51 (30—74) years. Preoperative and postoperative assessment included symptoms, barium swallow, 24-h pH monitoring.
Results: According to the preoperative data of barium swallow study, the median distance between the hiatus and gastroesophageal junction above diaphragm was 5.1 ± 1.5 cm. Type I HH was diagnosed in 57 patients, type III was diagnosed in 114 patients, type IV was diagnosed in 8 patients. Without Collis gastroplasty, at least 2.5 cm intraabdominal esophageal length was obtained by only mediastinal esophageal mobilization in 168 patients. In 11 cases, this was not enough to achieve the desired length, so a posterior vagotomy was added. There were no in-hospital or 30-day mortality. Mean hospitalization was 2.7 days. Conversion to open procedure was performed in 1 case. The duration of the operation was 98 ± 15 min. A mesh was used in 131 patients. At a median objective follow-up of 24.5 months (10–48 months), there have been revealed 13 (7%) symptomatic recurrences. Quality of life according to the GERD-HRQL questionnaire was assessed in 88% of patients. It was improved from 17.2 ± 8.3 (3–33) before surgery to 4.4 ± 2.3 (0–16) after surgery. The complete proton pump inhibitors independence was achieved in 84%. The mean DeMeester score decreased from 69.4 ± 17 to 16.6 ± 8.4 (p < 0.01).
Conclusions: In patients with large HH an adequate length of intraabdominal oesophagus can be achieved by an extensive mobilization of the esophagus from mediastinal structures. In this way, the complications commonly believed to be caused by Collis gastroplasty can be avoided.
Upper GI—Reflux-Achalasia
P266—Complex surgical treatment of oesophageal achalasia in the era of minimally invasive surgery: short- and long-term results
László Andrási1, A. Paszt1, Z.S. Simonka1, S.Z. Ábrahám1, M. Erdős1, A. Rosztóczy2, G. Ollé2, Gy. Lázár1
University of Szeged, 1Department of Surgery, 2Department of Internal Medicine, Hungary
Aims: We have analysed the short- and long-term results of various surgical therapies for achalasia, especially changes in postoperative oesophageal function.
Methods: Between 2008 and 2017, 54 patients with oesophageal achalasia were treated in our institution. Patients scheduled for surgery underwent a comprehensive gastroenterological assessment pre- and post-surgery. Forty-eight of the elective cases involved a laparoscopic cardiomyotomy with Dor’s semifundoplication, while two cases entailed an oesophageal resection with an intrathoracic gastric replacement for end-stage achalasia. Torek’s operation was performed on two patients for iatrogenic oesophageal perforation, and two others underwent primary suture repair with Heller–Dor surgery as an emergency procedure. The results of the different surgical treatments, as well as changes in the patients’ pre- and postoperative complaints were evaluated.
Results: No intraoperative complications were observed, and no mortalities resulted. During the 12–24-month follow-up period, recurrent dysphagia was observed mostly in the spastic group (TIII: 33%; diffuse oesophageal spasm: 60%), while its occurrence in the TI type did not change significantly (14.5%—20.8%). As a result of the follow-up of more than two years, good symptom control was achieved in 93.7% of the patients, with only four patients (8.3%) developing postoperative reflux.
Conclusions: The laparoscopic Heller–Dor procedure provides satisfactory long-term results with low morbidity. In emergency and advanced cases, traditional surgical procedures are still the recommended therapy.
Upper GI—Reflux-Achalasia
P267—How’s the efficacy of Heller’s operation with fundoplication on tackling achalasia? An experience from a single center
Shuk Wun Yu, K.F. Wong, S.K. Leung
Tuen Mun Hospital, Hong Kong, Surgery, China
Introduction: Achalasia is an esophageal motility disorder characterized by aperistalsis and failure of relaxation of the lower esophageal sphincter with loss of inhibitory innervation of the esophageal wall.
The study was to evaluate the efficacy of surgical management of achalasia.
Method: Patients diagnosed with achalasia undergoing laparoscopic Heller’s operation with fundoplication (± cholecystectomy) from 7/2008 to 6/2019 in Tuen Mun Hospital were reviewed retrospectively.
Results: There were 27 patients (Male: 12, female: 15) who received the surgery. Mean age and BMI were 46.8 (22–70) and 20.7 (15.2–27.1) respectively. Mean operation time was 152.1 min (94–247). Conversion rate from laparoscopic to open surgery was 0%.
The mortality rate in 30, 60 and 90 days was 0%. The 30 days morbidity is 3.7% (1 case). This patient was found to have esophagus perforation and required surgical repair on post operation day 2. He was discharged on post first operation day 15.
Mean follow-up time was 68.3 months (6–138). Mean Eckardt score dropped from 6.25 to 1.88 after operations. Only one case (3.7%) required endoscopic esophageal dilatation at post-operative 67 months due to recurrence of symptoms.
Conclusion: Laparoscopic Heller’s operation with fundoplication is an effective and safe surgical management of achalasia. It is the gold standard for treatment of achalasia with low incidence of postoperative gastroesophageal reflux.
Reference:
Endoscopic or surgical myotomy in patients with idiopathic Achalasia—New England Journal of Medicine 2019:381(23):2219
Gastro-esophageal reflux after POEM: lest we forget what we already know—Disease of the Esophagus, Volume 32, issue 12, December 2019
ASGE guideline on the management of achalasia—Gastrointestinal Endoscopy Volume 91, No. 2: 2020 213–227
Whose patient is it? The path to multidisciplinary management of achalasia–Journal of Surgical Research 2018: 228, 8–13.
EAES video award session
Hernia-adhesions—emergency surgery
V082—Winslow Hiatal Hernia. A feasible laparoscopic approach to small bowell obstruction in strange circunstances
Jaume Comas Isus1, A. Centeno Álvarez2, H. Subirana Magdaleno2, M.A. Cesardo3, J. Castellví i Valls1
Consorci Sanitari Integral—Hospital General de l'Hospitalet, 1General Surgery, 2Abdominal Wall Unit, 3Hospital Vall d'Hebrón, Spain
Aims: This video aims to present a rare case of acute small bowel obstructions (ASBO) due to an internal hernia and a feasible minimally invasive option for treating it.
Methods: A 35-year-old woman presents to the emergency room with high bowel occlusion symptoms, with the sole previous surgery of laparoscopic appendectomy. Due to her medical history and with the suspected diagnosis of a simple ASBO, based on radiological findings (see Fig. 1 attached), a laparoscopic approach is chosen.
Results: This video shows how to acces the abdominal cavity when importantly distended loops are present, and how to operate with then without injuring them. It also shows a rare case of internal Winslow hiatal hernia and a minimally invasive option for treating it.
Conclusion: Laparoscopic approach to the abdominal cavity is feasible even when distended loops are present in the context of an ASBO. Minimally invasive treatment of bowel obstruction is safe and feasible in selected cases.
Colorectal—benign
V083—ICG Fluorescence-guided laparoscopic sigmoidectomy for diverticular colovesical fistula: a step by step demonstration
Mariam Bajawi, Luz Divina Juez, P. Abadia, J.D Pina, A. Ballestero, I Moreno, G. Rodriguez Velasco, J.C Garcia Perez, P. Muñoz, A. Gonzalez Barranquero, J. Die Trill
Hospital Universitario Ramón y Cajal, Cirugía General y del Aparato Digestivo, Spain
Introduction: Colovesical fistulas secondary to diverticular disease may be considered a contraindication to the laparoscopic approach. The feasibility of laparoscopic management of complicated diverticulitis has been demonstrated. However, few studies on the laparoscopic management of diverticular colovesical fistulas exist.
Case presentation: We present the case of a 55 year old male patient with a past medical history of colovesical fistula. The colonoscopy showed a fixed, erythematous segment, 25 cm from the anal verge. Histopathology showed chronic inflammation and diverticulosis. Further investigations included a computed tomography CT demonstrating a circumferential thickening of a long segment of the sigmoid colon. Associated to a small perivesical collection and intracystic air. These findings related to a colovesical fistula of inflammatory or neoplastic origin. The magnetic resonance imaging MRI displayed findings suggesting a chronic inflammatory process in the sigmoid colon leading to colovesical fistula formation. There were no signs of malignant transformation. Barium enema demonstrated passage of the contrast from the colon de the bladder. Cystoscopy showed inflammation in the posterior wall of the bladder, but no clear fistula. Cystography showed extravasation of contrast material.
En bloc laparoscopic sigmoidectomy and partial resection of the bladder was performed, with closure of the bladder defect in two planes. A meticulous isolation and skeletonization of the ureter from the sigmoid colon was carried out. A circular stapled end‐to‐end intracorporeal colorectal anastomosis was performed. The vascularity was assessed with the aid of indocyanine green fluorescence.
The postoperative recovery was uneventful, with an early start of diet and ambulation. The patient was discharged on the seventh postoperative day.
High pressure cystography was performed in the third postoperative week without evidence of leakage.The final histopathological report exhibited a colovesical fistula. Chronic serositis and fibrosis. Lymph nodes: Lymphoid Follicular Hyperplasia.
Conclusions: The magnified view provided by laparoscopy can help identify an adequate dissection plane. Laparoscopic resection of diverticular colonic disease, with fistulization to neighbouring organs is, however, a technically demanding procedure, and should be performed by laparoscopic surgeons with extensive experience in advanced colorectal surgery.
Robotics & new techniques—flexible surgery
V084—Laparoscopic transabdominal pre-peritoneal umbilical hernia repair using advanced flexible medical device
Ludovica Baldari1, A Szold2
1Fondazione IRCCS Ca' Granda Ospedale Maggiore Policlinico Milano, Department of Surgery, Italy. 2Assia Medical Group, Assuta Hospital, Tel Aviv, Assia Medical Group, Department of Surgery, Israel
Aims: This video shows our technique to perform a laparoscopic transabdominal preperitoneal (TAPP) repair of an umbilical hernia using an advanced robotized laparoscopic device (HandX, Human Xtensions). Characterized by the advantages of robotics, this motorized laparoscopic device facilitates complex maneuvers allowing articulation with eight degrees of freedom.
Methods: The patient is a 36-years-old man with several months’ history of abdominal discomfort and pain in the umbilical region associated with a non-reducible lump at the same level, that increased in size with Valsalva maneuver. Abdominal US showed the presence of adipose tissue protruding through a 2.5 × 1 cm fascial defect in keeping with umbilical hernia.
The patient was scheduled for a laparoscopic TAPP umbilical hernia repair. The patient was placed in supine position and three trocars were used in the left quadrants. The peritoneum, with the preperitoneal fat, was dissected from the posterior fascia of the rectus abdominis muscles creating a peritoneal flap. Once the flap was completed, the suspected umbilical hernia was confirmed and reduced exposing the fascial defect, that was closed using a non-resorbable barbed running suture. A 12 cm round mesh was placed and secured with a single, trans fascial suture. The HandX device allowed a comfortable closure of the median defect even in horizontal orientation. The peritoneal flap was closed through a non-resorbable barded running suture.
Results: The postoperative course was uneventful and the patient was discharged on the same day. On follow up visit there was good healing and no pain.
Conclusion: Laparoscopic transabdominal preperitoneal umbilical hernia repair is a safe and feasible procedure. The HandX device used allows a comfortable closure of the defect and of the peritoneal flap regardless of the orientation.
Colorectal—malignant
V087—Laparoscopic CME and CVL for right colon cancer using critical views with all steps completed by trainees
Ken Campbell, Sameera Sharma, A .Pazidis, S. Sharma
Ninewells Hospital & Medical School, Colorectal Surgery Unit, United Kingdom
Complete Mesocolic Excision with Central Vascular Ligation is becoming widely accepted as a technique to improve the outcome for right sided colon cancers. The dissection involves the superior mesenteric vein and concerns are still expressed regarding the potential for increased morbidity although several series have now demonstrated that it can be safely performed laparoscopically with good results in expert hands.
An ongoing criticism is that the technique is too complex for trainees and it will remove a valuable training opportunity at the start of laparoscopic colorectal practice.
This video shows a patient with an hepatic flexure cancer undergoing CME and CVL using the "critical views" concept (Surgical Endoscopy (2018) 32:5021–5030). All steps of the dissection were completed by trainees under supervision aided by a “roadmap” of images of the vascular anatomy. The patient made an uncomplicated recovery.
The video demonstrates that using a structured approach to CME, trainees at all stages can be involved and advance their operative skills and insight into the vascular anatomy of the right colon. In our view surgery should be driven by oncological rather than training considerations and CME seen as an opportunity to equip trainees to provide that standard.
Colorectal—malignant
V088—Application of proposed parameters for a D3 lymphadenectomy in a right hemicolectomy: the pathology report
María Alfonso García1, A. Garcia-Granero1, 2, G. Pellino3, F. Giner4, A. Valverde Navarro7, V. Primo Romaguera5, 6, A. Ochogavia Segui1, 2, M. Gamundi Cuesta1, 2, X. Gonzalez Argente1, E. Garcia-Granero5
Hospital Universitari Son Espases, 1Digestive and General Surgery, 2Colorectal Surgery, Spain. 3Università Campania “Luigi Vanvitelli", Department of Medical, Surgical, Neurological, Metabolic and Ageing Sciences, Italy. Hospital Universitario y Politéctico la Fe, 4Department of Pathology, 5Digestive and General Surgery, 6Colorectal Surgery, 7University of Valencia, Human Embryology and Anatomy Department, Spain
Aims: no agreed standards of reporting are available to define D3 lymphadenectomy for right colectomy. Two anatomic variables have been proposed as reference standards to assess the quality of the lymphadenectomy. One of them is the trunk of the superior right colic vein (SRCV) and the other, the mesocolic sail, delimited by the surgical trunk of Gillot and the ileocolic vessels. Our aim is to demonstrate the correct application of the surgical technique through a laparoscopic approach.
Methods: First phase in cadaver, in which the bases of the surgical technique are established, with the proposed anatomopathological standards. High ligation of ileocolic vessels, dissection of the surgical trunk of Gillot and section of the SRCV at its entrance in the gastrocolic trunk of Henle.
Second phase, in which oncological right hemicolectomy is performed using a laparoscopic approach, respecting these parameters.
Results: Analysis of the surgical specimen, determining the preservation of the mesocolic sail, due to the presence of the surgical trunk of Gillot and the ileocolic vessels. In addition to the high ligation of SRCV for the performance of a wide lymphadenctomy. The total number of lymph nodes was 25, of which 8 were positive, of these, 5 were in the area defined as D3 lymphadenectomy, being one of them positive.
Conclusions: The mesocolic sail and the trunk of the SRCV are reproducible anatomopathological standards that allow the performance of an extensive lymphadenectomy with a greater number of isolated lymph nodes.
Ideo presentations
Bariatrics—laparoscopic
V052—Hiatoplasty and Re-sleeve after SADI-S in a patient with recurrent hiatal hernia and severe GERD
Ruth Blanco-Colino, L. Vidal, R. Vilallonga, A. García, P. López Luza, N. Fernandes, M.J. Gómez Jurado, J.M. Fort López-Barajas, E. Caubet Busquet, O. González López, A. Ciudin, A. Zabalegui, M. Comas, M. Armengol Carrasco
Vall d’Hebron University Hospital, Universitat Autònoma de Barcelona, General Surgery Department. Endocrine, Metabolic and Bariatric Surgery Unit, Spain
Background: Symptomatic gastroesophageal reflux disease (GERD) is a common outcome in patients with previous sleeve gastrectomy that need revisional bariatric surgery. Best technique to manage GERD after Single Anastomosis Duodeno–Ileal bypass with Sleeve gastrectomy (SADI-S) is still controversial.
Objectives: We aimed to report our experience as centre of excellence in a case with severe GERD after SADI-S. We performed a hiatoplasty and Bio-A mesh reinforcement associated with re-sleeve.
Methods: A 48-year-old woman with BMI 32.9 and previous SADI-S procedure in 2020 presented hiatal hernia and severe GERD in postoperative follow-up. Esophago-gastric transit showed hiatal hernia. Revisional laparoscopy is decided.
Results: Re-sleeve of fundus is performed to resize enlarged previous gastrectomy. Hiatus is dissected after adherences liberation. Hiatoplasty with non-absorbable suture is performed. A Bio-A Mesh was placed sutured at each pillar of the hiatus with non-absorbable monofilament to reinforce the hiatus. No complications in the follow-up were presented and GERD symptoms were controlled.
Conclusion: Re-sleeve with hiatoplasty seems feasible and a safe technique for GERD management after SADI-S surgery. It can be considered as a possible option in bariatric revisional surgery for reflux.
Bariatrics—laparoscopic
V055—Conversion to normal anatomy of a gastric bypass using circular mechanical gastro-gastric anastomosis in a patient who presents hypoglycemia
Elsa García Möller, R. Vilallonga, E. Caubet, A. Garcia Ruiz de Gordejuela, O. González, M. Beisani, L. Vidal, J.M. Fort, A Manel
Vall d’Hebron University Hospital, Universitat Autònoma de Barcelona, Endocrine, Metabolic and Bariatric Unit, General surgery Department, Spain
Introduction: In this video we present the case of a 50-year-old woman that underwent a Roux-en-Y gastric bypass, who presented hypoglycaemias involving loss of consciousness reason why it was decided to convert to normal anatomy using a circular mechanical gastro-gastric anastomosis and performing a vertical gastrectomy.
Case description: In this video, we present the case of a 50-year-old woman, who underwent a Roux-en-Y gastric bypass (RYGB) due to a BMI of 39 kg /m2, insulin-dependent type 2 diabetes mellitus, dyslipidaemia and sleep apnoea-hypopnea syndrome. During the intervention, it was decided to perform a 100 cm alimentary limb and 180 cm biliopancreatic limb.
Three months after surgery, she consulted for oral intolerance, reason why an esophagogastroscopy was performed, which did not show abnormalities. She improved clinically over the next months. A year later, she had lost an excess weight of 30 kg (BMI 26.4 kg/m2) with comorbidities resolution, but began to report episodes of postprandial neuroglycopenia, with multiple episodes of loss of consciousness. Therefore, an oral glucose tolerance test was conducted, which registered hypoglycaemias of 58 mg/dl. A second esophagoendoscopy was performed, which again did not show abnormalities. A conservative treatment with acarbose was started, without positive results. Finally, it was decided to convert the gastric bypass to normal anatomy.
Intraoperative, multiple flanges were found upon the alimentary limb and gastro-enteric anastomosis. Adhesiolysis was performed and the entire bypass was anatomized, finding a 45 cm alimentary limb and a 120 cm biliopancreatic limb, leaving just 350 cm of common limb. Section of the gastro-enteric anastomosis and jejuno-jejunostomy were performed. A 29 mm EEA was placed between the gastric pouch and the gastric remnant to perform a transabdominal gastro-gastric mechanical circular anastomosis. Subsequently, a vertical gastrectomy was done, using the last load to adjust the circular anastomosis.
The patient had a favourable immediate postoperative period and was discharged 72 h after surgery. Follow-up showed total remission of hypoglycaemias.
Discussion Hypoglycaemias following RYGB can be dangerous and put the patient's life at risk, therefore a prompt and accurate treatment should be carried out. This video demonstrates that converting gastric bypass to normal anatomy using a circular mechanical gastro-gastric anastomosis can be a successful surgical solution.
Bariatrics—laparoscopic
V185—Single-stage laparoscopic adjustable gastric band removal and sleeve gastrectomy
Vasileios Drakopoulos, N. Morfis, K. Rekouna, M. Chistou, C. Kontovazainitis, V. Vougas
Evangelismos General Hospital, 1st Dep. of Surgery and Transplant Unit, Greece
Background: Revision procedures after Laparoscopic Adjustable Gastric Band placement are often necessary in cases of severe band-related complications, inadequate weight loss or weight regain. Inflammation and foreign body reaction make the procedure of band removal technically demanding.
Introduction: Laparoscopic Adjustable Gastric Band (LAGB) related complications often require revision procedures with band removal and/or conversion to Laparoscopic Sleeve Gastrectomy (LSG) or Roux-en-Y Gastric By-pass (RYGB). The optimal method of revision remains controversial. Single-stage removal and LSG or RYGB seems to be safe and efficient, while others suggest a two-stage approach.
Objectives: We present our 7-year experience from May 2014 to April 2021 concerning simultaneous LAGB removal and LSG.
Methods: All patients underwent preoperative endoscopy and barium swallow, with no sign of stomach perforation, erosion or severe band slippage. We emphasize on a case of a 41-year-old male, who had undergone two operations of gastric band placement. The first band had developed slippage, while the second one infection without erosion. However, a successful single-stage definitive LAGB removal and LSG was achieved.
Results: No severe postoperative complications were mentioned, while no conversion to open surgery was required. Mean weight loss in the first year was 70% of the excess weight.
Conclusion: Simultaneous laparoscopic gastric band removal and sleeve gastrectomy for morbid obesity seems to be safe and efficient, especially in cases of absence of gastric erosion.
Bariatrics—laparoscopic
V186—Laparoscopic Roux-En-Y mucosal patch for sleeve leak
Elena Payno Morant, Pablo Priego Jimenez, P. Muñoz, J. Nuñez, D.A. Lopez Curtis, S. Sanchez Picot, M. Cuadrado Ayuso, L.A. Blazquez Hernando, A. Santana Valenciano, J. Galindo Álvarez, J.M. Fernandez Cebrian
Hospital Umiversitario Ramon y Cajal, General and Digestive surgery, Spain
Aims: Late gastric sleeve leak is an uncommon complication and generally requires surgical treatment. Revision surgery in these patients includes: primary suture with omental coverage, conversion to gastric bypass, fistulo-jejunostomy, or total or subtotal gastrectomy.
Methods: We present the video of the revision surgery of a 50-year-old patient who underwent gastric sleeve 10 months before. The patient presented a late leak 4 months after the intervention. Conservative management was attempted with a poor response, so conversion to laparoscopic gastric bypass was decided. The defect was covered with an intestinal patch of jejunum, using the alimentary limb, 20 cm proximal to the gastrojejunal anastomosis.
Results: One week after surgery, esophagogastric transit was performed without evidence of contrast leak. The postoperative evolution was correct and the patient was discharged after 10 days.
Conclusions: Late gastric sleeve leakage generally presents a poor response to conservative treatment. Conversion to bypass is a widely extended option, however it is limited when the leak is at the angle of His, close to the esophagogastic junction. In these cases, the intestinal patch can avoid gastrectomy in selected patients, when the quality of the dehiscent tissue does not allow the fistulojejunostomy to be performed safely. Gastrojejunal fistula is acceptable and does not increase morbidity in these patients.
Bariatrics—laparoscopic
V187—Conversion of single anastomosis Duodeno-Ileal Bypass with Sleeve Gastrectomy in Roux-en-Y gastric bypass for gastroesophageal Reflux disease
Catarina Osório, L. Carvalho, A. M. Pereira, M. Guimaraes, M. Nora
CHEDV, General Surgery, Portugal
Obesity is a risk factor for GERD and also esophagitis and esophageal adenocarcinoma. BMI and abdominal perimeter are associated with GERD because of the increase of intra-abdominal pressure. SADI-S procedure involves a sleeve gastrectomy confection with pylorus preservation, which allows an increase of intra-luminal pressure and predisposition for GERD. The conversion to Roux-en-Y Gastric Bypass can reduce the pressure within the gastric pouch, treating the GERD. We present a case of a 57 year-old woman submitted to a SADI-S five years ago for morbid obesity. After the surgery, she presented symptoms of GERD non responding to medical treatment. Bioimpedance analysis described gastroesophageal reflux (acid and biliar) with Deemester score of 44. Manometry and upper GI endoscopy were normal. Thus, the patient was proposed to laparoscopic conversion of SADI-S to Roux-en-Y Gastric Bypass with gastrectomy of the remnant stomach. Surgical procedure was preformed without complications. The patient was discharged at day 3 post-op and one month after surgery presented with complete resolution of the GERD symptoms and with a weight lost of 15 kg (BMI 41,5—> 35,5 kg/m2). The confection of a vertical gastrectomy in the SADI-S procedure can induce GERD. The conversion to Roux-en-Y Gastric Bypass is a good solution when SADI-S fails and acid reflux appears.
Bariatrics—laparoscopic
V188—When I find myself in times of trouble—a troublesome anastomosis
Gil Faria, A.P. Moreira, L. Sá Vinhas
Trofasaúde Hospital—Trofa, Surgery, Portugal
Laparoscopic Roux-en-Y Gastric Bypass is the gold-standard surgery for the treatment of morbid obesity. Performing laparoscopic surgery in morbidly obese patients is of increased complexity, given the reduced pneumoperitoneum cavity associated with increased abdominal pressure and visceral obesity.
We present the case of a 70-year old lady with a BMI of 54 and severe metabolic syndrome. After pre-operative screening and multidisciplinary evaluation, she was proposed to laparoscopic Roux-en-Y Gastric Bypass. Here we present a troublesome gastro-jejunostomy. In the first attempt to perform the anastomosis, there was a rupture of the anti-mesenteric border of the jejunum. In the second attempt to perform the anastomosis, the calibration tube was incorporated in the gastrojejunostomy and a pouch re-resection and re-anastomosis was required.
We believe this is an educational video since two of the most fearsome intra-operative complications during an anastomosis, occurred in the same patient.
Bariatrics—laparoscopic
V189—SASI bypass as a revision surgery for sleeve gastrectomy non responders: 2 years follow up
Ibrahim Hassan, M.B.A. Alhaifi
Sidra Hospital, Bariatric surgery, Kuwait
Introduction:-Single Anastomosis Sleeve Ileal Bypass(SASI)is a Novel Metabolic/Bariatric Surgery operation based on Santoro’s bipartition operation.It can be offered for patients with weight regain after Sleeve gastrectomy.
Sleeve gastrectomy (SG)is a commonly performed bariatric procedure.Weight regain following SG is a significant issue.Yet,the understanding of this phenomenon is still unclear.Rates of regain ranged from 5.7% at 2 years to 75.6% at 6 years.SASI bypass was an option for some candidates having SG done 2 years back and failed to achieve the required weight loss or having weight regain.In SASI bypass,Resleeve gastrectomy of the dilated gastric pouch is done followed plication of the stapler line then creating a Bipartition channel doing a side to side gastro-ileal anastomosis.
Aim: The aim of this study is to report the clinical results and the outcomes of SASI bypass as a therapeutic option for patients with weight regain after SG.
Methods: We conducted a retrospective study for 75 morbidly obese patients having history of SG done more than 2 years back and failed to achieve and/or to maintain the required BMI.
Exclusion criteria: Patients with history of Bypass Bariatric Surgery and patients with documented psychological instability or intolerability for regular follow up.
Procedure was done at Sidra Hospital in kuwait from February 2017 to November 2019.
Using 5 ports,Resleeve Gastrectomy was performed over36 fr bougie tube starting 6 cm above the pylorus then gastro-ileal anastomosis (side to side)was performed 6 cm above the pyloric ring to an ileal loop counted 300 cm from the ileocaecal valve.
Data was collected from the patients including:Weight loss progress,laboratory full results.
Discussion and Results: During the study period:75 morbidly obese patients with a mean BMI of 44 ± 6 kg/m2 were evaluated.-%EWL(excess weight loss)reached 64% at two years-Diabetes was cured in the known diabetic patients (type2)within 6 months. Follow up laboratory results were normal in 88% of patients (all were kept on regular vitamins and proteins supplementation for 2 years).
3 patients had hiatal hernia that was repaired during the procedure and 2 patients had asymptomatic gall stones that was discovered during the routine preoperative work up for whom Laparoscopic cholecystectomy was done at same cession before starting the SASI procedure.
Conclusion: SASI Bypass is a promising operation that offers a good weight loss for morbidly obese patients having weight regain after SG.
Figure 1
Bariatrics—robotics
V057—Totally robotic revisional surgery for an obese patient with severe Reflux after Sleeve Gastrectomy. Key points and advantages of Robotic Technology
Maria Jose Jurado, R. Mata, R. Vilallonga, O. Gonzalez, E. Caubet, A. Garcia Ruiz de Gordejuela, J.M. Fort
Vall d’Hebron University Hospital, Endocrine, Metabolic and Bariatric Unit, Spain
Aims: Revisional surgery has a major complexity in bariatric surgery. We want to expose with this video the main advantages of DaVinci® platform, which could balance the inconvenience of a more demanding procedure.
Methods: A totally robotic gastric by-pass (GBP) with hiatoplasty is performed under general anesthesia in a patient with gastroesophageal reflux (GER) and a previous sleeve gastrectomy (SG). We performed it with 4 robotic and 2 assistant trocars, one for the airseal and one for the liver retractor.
Results: A 52-year-old woman, with a SG 6 years before, develops severe GER and hiatal hernia. Also, she has a weight regain with an actual BMI 35 kg/m2 associated with comorbidities despite a good adherence to treatment. We decided to do a revisional surgery with a Roux-en-Y GBP and an hiatoplasty associated. We start dissecting the right and left crura with hiatal hernia reduction, being easy to perform thanks to the robotic technology skills in narrow spaces. We continue releasing the posterior gastric surface with the inconvenience of all the adhesions in the previous stapler line of the lateral gastric surface. We finally performed a classic Roux-en-Y GBP. We included the closure of the mesenteric defects, which we can do in a more ergonomic way robotic than laparoscopic due the position of the trocars. The patient was discharged home the second postoperative day without incidence. At 12 months of follow-up, she referred a full resolution of GER symptoms and a TWL of 41%.
Conclusion: The complexity of revisional surgery could be partially balanced thanks to the ergonomic and technical advantages that robotic technology brings us in comparison with laparoscopic surgery. More studies should be promoted in this direction to objectify this theory.
Bariatrics—robotics
V190—Totally robotic second stage of SADI-S, case report
Sergi Sanchez-Cordero1, R. Vilallonga Puy2, A. Garcia de Gordejuela2, O. Gonzalez2, E. Caubet2, M.J. Gomez-Jurado3, J.M. Fort2
1University Hospital of Igualada, General surgery, Vall Hebron Hospital, 2Endocrine-Metabolic and Bariatric Unit, 3General Surgery department, Spain
Background: Robotic surgery is an emerging and promising technology in bariatric surgery. Current studies have confirmed its feasibility and safety with a relatively short learning curve. The advantages for the surgeon are already well established. Single anastomosis duodenoileal bypass with sleeve gastrectomy (SADI-s) is a well-known technique for extreme obesity but technically challenging in this group of patients and so frequently is performed as a laparoscopic staged procedure. Robotic devices such as Da Vinci® system may solve some limitations of laparoscopic surgery. The video show a second stage of a totally robotic SADI-S (TR-SADI-S) on a patient with extreme morbid obesity.
Methods: 46-year-old male patient with initial weight of 151 kg and BMI 47.78 kg/m2 a two stage SADI-S was proposed. Sleeve gastrectomy was performed in 2017. Before second stage, 102 kg and BMI 32 kg/m2. A Da Vinci Xi® model was used and neither laparoscopic assistance nor change of surgical table position was needed.
Results: The patient was placed in Trendelenburg and left-side position during all the procedure. All trocars were robotic. A 300-cm ileal loop was measured and temporarily attached to the right hypochondrium peritoneum. A robotic hand-sewn four-layer duodenoileal anastomosis was performed with barbed absorbable sutures. No hiatal hernia was identified. There were no complications during or after surgery, and the patient was discharged on the third postoperative day.
Conclusions: Totally robotic surgery can be safely performed through systematic stepwise progression with minimal complications and comparable operative times. Robotic platforms can significantly minimize the difficulty of bariatric surgery. The potential benefits to the patient are still being studied. Robotic surgery seems to offer more advantages for complex cases, such as super obesity and revisional surgery. Further experience is needed to understand the long-term advantages and disadvantages of the totally robotic approach.
Bariatrics—robotics
V191—Robotic revision of gastro-gastric fistula on marginal ulcer in Roux-en-Y gastric bypass
Elsa García Möller1, R. Vilallonga2, E. Caubet2, A. Garcia Ruiz de Gordejuela1, M. Pera2, O. Gonzalez2, J.M. Fort, A. Manel1
Vall d’Hebron University Hospital, Universitat Autònoma de Barcelona. Center of Excellencefor the EAC-BC., 1General surgery Department, 2Endocrine, Metabolic and Bariatric Unit, Spain
Introduction: This video presents the case of a 61-year-old man that underwent Roux-en-Y gastric bypass who 6 years later was diagnosed of a gastro-gastric ulcer upon a marginal ulcer on the gastro-enteric anastomosis. The aim is to describe the technical steps to resect an anastomotic ulcer and convert the gastro-gastric fistula to a novel gastric bypass using robotic surgery.
Case description: This video presents the case of a 61-year-old man that underwent Roux-en-Y gastric bypass (RYGB) in 2013 due to a BMI 47.23 kg/m2. Five years after bariatric surgery, the patient started to complaint of epigastric pain, vomiting and difagia, reason why a gastroscopy was performed, which found a marginal ulcer on the posterior wall of the gastro-enteric anastomosis, classified as Forrest III, which was treated conservatively. A year later, due to persistence of the previously described symptoms and weight regain, a barium swallow tests and a second gastroscopy were conducted, which revealed a large gastro-gastric fistula between the gastric pouch and gastric remannent, with no other fistulas nor strictures.
Robotic surgery was proposed in order to give a definite treatment. Intraoperatively, first the the gastro-jejunal anastomosis was dissected in order to see the perforated ulcus on its posterior surface, which fistulized towards the gastric remnant. Disconnection of the anastomosis was performed. Hiatal hernia was opened to be able to close the diaphramic pillars with 3 ethibond points. Excision of the distal part of the gastric pouch was conducted, as well as the pouch’s resyzing with robotic green stapler and vertical section reinforcement with PDS. Reanastomosis of gastro-yeyunostomy was carried out with a blue robotic stapler and closure reinforcement with a manual double plane of vycril and PDS. Furthermore, a Candy Cane resection was performed with a blue stapler. The Petersen’s defect was reclosed with Ethibond. Furthermore, the fistulous orifice in the gastric remnant was closed with continuous vicryl suture. Finally, exluded parts were extracted, hemostasia controlled, and with methylene blue the absence of leaks in the gastroyeyunal anastomosis was verified.
The patient had a favourable immediate postoperative period and was discharged 48 h after surgery.
Discussion: Although gastro-gastric fistula after RYGB is a rare complication, it is important for the bariatric surgeon to be able to recognize its signs and symtomps in order to offer a prompt and accurate treatment. Robotic technology has proven to be succesfull in its surgical management demonstrating good surgical outcomes.
Colorectal—benign
V192—Revisional metabolic surgery: omega loop (Mini) gastric by-pass after sleeve gastrectomy
Lucía González González, B. Pascotto, A. Sanoussi, O. Pavan, L. Legros, J.S. Azagra
Centre Hospitalier de Luxembourg, General Minimally Invasive (Laparoscopic and Robotic) Surgery, Luxembourg
This video is about a 46 years old woman with medical history of obesity, hypertension, dyslipidemia, oesophagitis and sleeve gastrectomy in 2007 for morbid obisity with BMI of 58. She arrived to our medical observation in 2020 for morbid obesity with 52 BMI, heartburn and drug-resistant gastro-oesophageal reflux. The preoperative set-up included a gastroscopy and a barium swallow x-ray showing a reflux oesophagitis and a sleeve abnormal dilatation.
The patient underwent a redo procedure consisting in a conversion of the sleeve into a mini-bypass.
The patient underwent a fast-track program so she started to eat liquid diet the same day of the operation and she has been discharged the 1st postoperative day without complications.
Colorectal—benign
V047—Laparoscopic sigmoid resection for colo-vaginal fistula due to diverticular disease with fluorescent ureter identification
Ludovica Baldari, E Cassinotti, C Bertani, M F Chiappetta, F Cantore, L Boni
Fondazione IRCCS Ca' Granda Ospedale Maggiore Policlinico Milano, Department of Surgery, Italy
Aims: This video shows our technique to perform laparoscopic sigmoid resection for colo-vaginal fistula in complicated diverticular disease with indocyanine green (ICG) fluorescence ureter identification.
Methods: The patient is a 67-years-old woman with past history of open hysterectomy and bilateral salpingo-oophorectomy for fibroids and known diverticular disease. Due to passage of stool and pus from the vagina, the patient underwent colonoscopy and gynecologic examination showing a colo-vaginal fistula. Abdominal CT scan confirmed the presence of severe diverticular disease associated with 1.5 cm colo-vaginal fistula.
The patient was scheduled for laparoscopic sigmoid resection. In order to better visualize the left ureter, an endoscopic stent was inserted through cystoscopy up to the renal pelvis, filled up with 4 cc of ICG and then partially withdrawn allowing ICG flow into the ureter. Laparoscopy was performed with four trocars. Adhesion between small bowel and sigmoid colon were divided. After partial mobilization of sigmoid colon, the fluorescence mode allowed ureter visualization due to ICG.
The mesentery of the colon was divided preserving superior rectal artery and dividing sigmoid vessels. ICG fluorescence to identify and hence preserve the ureter during the procedure was useful especially into the pelvis, at the level of colo-vagina fistula. A thick tissue connecting the sigmoid colon to the vagina has been identified and divided and sigmoid colon was fully mobilized from the vagina. The fistula tract was completely resected. After confirming the presence of a small defect on the vagina through methylene blue injection, the hole on the posterior wall was closed with absorbable sutures. The upper rectum was divided using an articulated linear stapler.
A sovrapubic mini-laparotomy was performed and sigmoid colon extracted. After completing division of the mesentery, perfusion control of descending colon was checked with ICG fluorescent angiography. A colo-rectal anastomosis was fashioned using circular stapler.
Results: The postoperative course was uneventful and the patient was discharged on postoperative day 6.
Histopathological examination confirmed the presence of diverticular disease with chronic inflammation.
Conclusion: ICG fluorescence for ureter identification is feasible and useful especially in some cases of abdominal and pelvic surgery like complex diverticular disease.
Colorectal—benign
V089—Trans anal minimally invasive surgery in emergency to treat a traumatic rectal perforation
Nuria Mestres Petit, D. Ambrona Zafra, M.T. Santamaría Gómez, J.E. Sierra Grañon, J. Ortega Alcaide, J.J. Olsina Kissler
Hospital Universitari Arnau de Vilanova de Lleida, Colorectal Surgery, Spain
Aims: Remark the use of TAMIS (transanal minimally invasive surgery) in Emergency Surgery to solve low rectal lesions in order to avoid diverting stomas.
Methods: Single case video of rectal repair via TAMIS after rectal traumatic perforation.
Results: We present a case of a 51 year old man with not known comorbidities that came to the emergency referring anal pain and rectal bleeding. He explained a traumatic introduction of a rectal foreign body three hours before. There was no history of abdominal surgery or trauma to the abdomen. On physical examination he had normal pulse, and blood pressure. He presented a middle-distended abdomen, not tender. There was no tympanism nor peritoneal irritation but intense pain in low inferior quadrants. Rectal exploration was difficult because of severe pain and sphincter spasm. Blood samples revealed acute reactants elevation (PCR), leukocytosis with neutrophylia and incipient coagulopathy. Due to the clinic and analytic findings a CT was ordered where rectal perforation was diagnosed showing pneumoperitoneum surrounding peritoneal reflection and in recto-vesical space. According with this findings a surgical exploration was proposed and accepted by the patient. We did a double approach via TAMIS and laparoscopy. We started exploring under general anesthesia the anal canal where we found a rectal perforation in the anterior wall of the inferior/middle rectum. We decided to explore via TAMIS the canal anal and to repair the defect with a barbed suture. Once the canal anal was explored and the defect closed without other findings we did a exploratory laparoscopy in order to explore peritoneal cavity. We found a non complicated hematoma just in the anterior peritoneal reflection without signs of active bleeding. We decided to do a ghost ileostomy in case the patient showed during the post-op any signs of pelvic infection. Recovery was uneventful and patient was discharged on 4rth postoperative day. After sic months of follow-up the patient remains with good functional results.
Conclusion: TAMIS is a safe and feasible technique with low morbidity that gives us an alternative to treat rectal traumatic disruptions in an emergency scenario allowing an increased number of organ preservation.
Colorectal—benign
V090—Post colonoscopy perforation, Tips and Trick for laparoscopic ileus cecal resection in obese patient & benefits of ICG use
Rafael Diaz Del Gobbo, G. Cardenas, I. Fornaguera, J.C. Baanante, M Valentino, C Ginesta
HM Delfos, General Surgery, Spain
Objectivies: The purpose of the video is to demonstrate technical details that facilitate dissection, in the case of a cecal perforation in an obese patient, and also to demonstrate the use of ICG in emergency surgery.
Methods: 71-year-old patient, hypertensive, arrhythmia with atrial fibrillation, BMI 40, sleep apnea. who undergoes fibrocolonoscopy 72 h before, findings 2 polyps of 3 mm and 5 mm in the cecum, they perform polypectomy and the patient is discharged, the first day at night begins with pain in the hypogastrium, right iliac fossa, the second day the discomfort Abdominals worsened, on the 3rd day he had asthenia, worsening of symptoms for which he went to the emergency room, the physical examination highlighted defense and signs of peritoneal irritation, analytical with c reactive protein of 300 and 14,000 leukocytes. An abdominal CT scan is requested that reports gas and free fluid in the right iliac fossa, with fat involvement, suggestive of perforation, it is proposed for emergency exploratory laparoscopy.
Results: using umbilical 11 mm trocar, suprapubic 12 mm trocar, 5 mm trocar in epigastrium, 5 mm trocar in right flank. the optic is on the umbilical trocar. Findings: in the right iliac fossa the cecum covered with purulent fluid and frankly hardened mesos, without clear signs of perforation, it´s an obese patient with voluminous mesos and omentum, making it difficult to assess the damage. It was decided to change the optics to the 12 mm trocar in the hypogastrium and the main working trocars are the umbilical and the right flank, this approach facilitates the opening of the told fascia and the mobilization of the cecum, where fecaloid material it is evident, identifying perforation on the mesenteric side, continuing with this maneuver, it is possible to mobilize the entire colon from the bottom to the top, from the lateral to the middle, releasing the hepatic angle (upper limit), and the terminal ileum (lower limit) and duodenum (medial limit). Once the entire colon had been mobilized, further damage is discarded, only perforation in the mesenteric aspect of the cecum were ruled out, so it was decided to perform ileocecal resection. extraction by means of an assisted incision in the right flank, transection of the meso of the affected area is performed, and to decide the area of the anastomosis, we use indocyanine green, delimiting the vascularized areas of the colon and ileum, it allows to select the area of the anastomosis with greater security,mechanical side-to-side anastomosis is performed. post-operative without incident discharge on the 4th day.
Conclusions:Colon perforations in the mesenteric aspect can be difficult to diagnose or go unnoticed even in laparoscopic surgery.
Laparoscopic mobilization of the colon from lateral to medial is a useful tool in obese patients.
The use of ICG in emergency surgery, helps to decide the creation of anastomosis in complex situations.
Colorectal—benign
V091—OVEr-the-SCOpe (OVESCO) clip closure closure of a right colon perforated and bleeding diverticulum: a video vignette
Johannes Maria Alberto Toti1, F. Mongelli4, M. Di Giuseppe1, S. Spampatti1, A. Saporito2, A. De Gottardi5, D. La Regina1, P. Majno-Hurst4, G. Lollo3, D. Christoforidis4
Ospedale Regionale di Bellinzona e Valli, 1Surgery, 2Anesthesia, 3Gastroenterology, Ospedale Regionale di Lugano, 4Surgery, 5Gastroenterology, Switzerland
Aim: Diverticulitis of the right colon is rare in western countries. We present the case of a perforated diverticulum of the right colon complicated by lower GastroIntestinal (GI) bleeding treated with endoscopic OVEr-the-SCOpe (OVESCO) clip placement.
Methods: A 61-year-old woman presented at the emergency department with a four-day history of right lower abdominal pain and fever. The blood tests showed a C-reactive protein of 222 mg/L and a leukocytosis (21.400 × 109/L). CT-scan schowed a single coprolith containg diverticulum of the right colon with stranding of the surrounding pericolic tissue, but no signs of free air. After 24 h of antibiotics, the patient developed life-threatening lower- GI bleeding, which required an emergency colonoscopy. Although no active bleeding was identified, a 6–7 mm large perforated diverticulum was evident. We decided to close the perforation using an OTSC Ovesco type t (size 14 mm). After the successful placement, the right colon was filled with iodinated contrast and a CT scan excluded persistent leakage.
Result: The clinical course was uneventful and the patient was discharged on four days later. After 2 months, a planned colonoscopy showed complete healing of the perforation and the OVESCO clip was removed.
Conclusion: We present a case of perforated diverticulitis of the right colon associated with relevant bleeding treated with the OVESCO clip. Although standard noninvasive treatment may also have been successful, this approach may have accelerated healing and prevented further bleeding or inflammatory recurrences. Further studies need to confirm such hypothesis.
Colorectal—benign
V092—Diverticular disease of the sigmoid colon and its complications (case study)
Oleksiy Pepenin1, L. Makartsov2, L. Bondarets2, A. Agzibegyan3, K. Vasilevsky2, I. Pepenin1
1Lugansk State Medical Universitate, Surgery, 2Lugansk regional Hospital, Surgery, 3City Hospital, Intensive, Ukraine
Diverticular disease of the sigmoid colon in recent years has acquired the status of a disease of civilization due to the widespread prevalence among citizencs of countries with a high standard of living. The absence of a characteristic clinical picture, diagnostic criteria, and pathognomonic manifestations causes significant difficulties in the timely diagnosis of this disease and its complications. The article presents a case of one of the complications, the incorrect diagnosis of which led to the surgeon’s mistake and served as the reason for the formation of a whole group of complications specific to diverticulitis. Diagnostic laparoscopy revealed a pronounced adhesion process of the abdominal cavity organs, dolichosigma, which is tightly soldered to the anterior abdominal wall in the area of the postoperative scar in the form of a loop. Two loops of the small intestine are soldered anterior to the sigmoid colon in the same place: one with the tip of Meckel’s diverticul, and the second loop with the mesenteric margin. A diverticulectomy (Meckel) was performed with suturing of the intestine with a transverse suture, the sigmoid colon was cut off through the fistula from the abdominal wall from the inside. Adhesiolysis, mobilization and resection of the sigmoid colon with the formation of a stapler anastomosis were performed. Performed simultaneous cholecystectomy. This clinical case clearly demonstrates one of the clinical masks of complications of diverticular disease, which served as a reason for choosing incorrect surgical actions. Moreover, the laparoscopic method of access using modern stapler and suture materials allows not only to make a timely diagnosis, but also to perform surgical treatment in the required volume.
Colorectal—benign
V093—Fully laparoscopic treatment of enterocutaneous fistula and incisional hernia after radical cystectomy
Cristina Soto Montesinos, R. Diaz Del Gobbo1, M. Labro, M. Bardaji, C. Gomez, J. Curto, R. Flores, A. Puig, L. Sanchon, A. Osorio, C. Guariglia, S. Pardo, P. Collera
Althaia Sant Joan de Deu, General Surgery, 1Abdominal Wall Surgery, Spain
Objectives: The objective is to demonstrate the possibility of a minimally invasive comprehensive treatment of a enterocutaneous fistula, together with an incisional hernia, after radical cystectomy.
Methods: 70 years old patient, obese BMI 36, with clinical history of rheumatoid arthritis under treatment with corticosteroids, history of open radical cystectomy + Bricker reconstruction October 2018 due to bladder carcinoma, presenting various postoperative complications, evisceration that is repaired with polypropylene mesh onlay, than later presented an enterocutaneous fistula that required a third surgery, an iterative exploratory laparotomy, findings a blocked abdomen, and the fistula was not identified. Conservative treatment, prolonged hospitalization, drainage, control of sepsis, and subsequent initiation of oral feeding was decided, the patient was discharged after two months with a low-debit fistula.
He went to the emergency room several times due to abscesses in the abdominal wall, plus sepsis. Percutaneous treatment with embolization of the fistulozoal tract with metallic coils was proposed repeatedly, without being effective. In the follow-up, herniation is diagnosed in the upper part of the laparotomy, so after 2 years with control of sepsis, nutritional optimization, and wound control, minimally invasive surgery is proposed to repair the fistula together with the incisional hernia.
Results: It was decided to perform a laparoscopic approach from the upper abdomen, pneumoperitoneum with verres at Palmer's point, optic trocar in the left flank and 1 trocar of 5 mm in the left hypochondrium and 1 trocar 5 mm in the left flank. We performed laborious adhesiolysis of bowel loops in the entire hypogastrium, predominantly in the midline, we observed segments of the onlay mesh that protruded towards the peritoneum. The loop of the intestine causing the enterocutaneous fistula is individualized, dissection of the fistula tract and transection with scissors is performed, infracentimetric fistulous orifice is evidenced, closure of the defect is performed with simple intracorporeal stitches + omentum patch. Since the surgery was uneventful, we continue with the repair of the eventration, M2W1, closure of the defect plus a Symbotex mesh using the IPOM technique (laparoscopic intraperitoneal onlay Mesh). covering the entire previous Onlay mesh exposed to the peritoneum and the eventration. The patient, star oral intake the first day and was discharged on the third postoperative day without complications.
Conclusions: Laparoscopic augmented vision in conjunction with pneumoperitoneum facilitates adhesion dissection even in complex cases.
Advances in minimally invasive techniques allow a comprehensive treatment of several simultaneous pathologies.
Collaboration between surgical teams abdominal wall and coloproctology is essential for the benefit of complex patients.

Colorectal—benign
V094—Complex Meckel’s Diverticulitis: laparoscopic management by junior trainee at night
Dileep Kumar1, J. Khan1, A. Dhahri2
1Ninewells Hospital / NHS Tayside, General Surgery, 2Princess Alexandra Hospital NHS Trust, Harlow., General Surgery, United Kingdom
Meckel’s diverticulum is most common gastrointestinal anomaly diagnosed during surgery for other reasons. In diagnostic laparoscopy for provisional acute appendicitis, where the normal appendix is found, one must look for Meckel’s diverticulum. Laparoscopic Meckel’s resection has been recognized as a safe technique both in pediatric and adult patients; however, it requires considerable skills to perform Meckel’s surgery laparoscopically.
This video is of a 43 years old gentleman presenting with < 24 h history of migratory right iliac fossa pain with tenderness, rebound and guarding at McBurney’s point. The patient had WCC 12.4 with CRP 33, and normal urine analysis. The patient was considered for diagnostic laparoscopy without preoperative imaging due to the classical presentation of appendicitis.
On-call trainee registrar (ST4 level) with junior doctor started diagnostic laparoscopy at midnight, with 10 mm infra-umbilical port by open technique and two 5 mm ports using 5 mm 30-degree scope. Laparoscopy revealed normal appendix, but purulent fluid in pelvis and a long Meckel’s diverticulum with mesentery, which is not very common. It was adherent to the anterior abdominal wall just below the umbilical port and small bowel mesentery with necrotic tip, making it a complex procedure. It is always safe to put first port by open technique to avoid any damage to bowel, in this case Meckel’s, adherent to anterior abdominal wall.
Un-scrubbed on-call consultant supervised trainee to perform the entire operation including adhesiolysis with diathermy hook, dissection of Meckel’s mesentery using Ligasure Maryland forceps. 10 mm infra-umbilical port was converted to 12 mm port to pass Endo-GI stapler for diverticulectomy.
Complex Meckel’s diverticulectomy can be safely performed laparoscopically by a trainee. However, it requires considerable laparoscopic skills of small bowel handling, safe use of energy devices and Endo staplers. 10 mm port site can be upsized for 12 mm port. 5 mm scope is very handy in procedures involving complex appendicitis or Meckel’s diverticulitis and can avoid additional 10 or 12 mm port for Hem-o-Lok or Endo GI stapler.
Colorectal—benign
V173—Laparoscopic sigmoidectomy for volvulus of sigma
Maria Gallego Gotor, A. Sánchez López, G. Planas, I. Fornaguera Marimon, J.M. Bollo Rodriguez, Martinez Sanchez, P. Hernandez Casanovas, E. Targarona Soler1
Hospital de la Santa Creu i Sant Pau, Colorrectal Surgery—General and Digestive Surgery, 1Director of the Unit of Gastrointestinal and Hematological Surgery, Spain
Objectives: Colon volvulus consists of a closed loop obstruction, caused by intestinal malrotation over the mesenteric axis, which can lead to rapid progression to mechanical vascular hypoperfusion, ischemia, gangrene and finally to the perforation of the intestinal segment involved. Volvulus sigmoid is a rare cause of intestinal obstruction, although it is more prevalent in elderly people, we can find from secondary cases to other conditions (Hirchprung's disease, Chagas disease, connective tissue diseases, etc.) that appear in young patients. In particular it constitutes the third cause of mechanical obstruction of the large intestine in pregnancy and in the puerperium according to the series. In cases in which that happens at midlife, increasing the risk of recurrence over the years, we face a benign pathology with important repercussions on the patient’s quality of life, making it necessary to propose a definitive solution through surgical techniques.
Material and methods: We present a case of a 45-year-old patient who underwent elective surgery after multiple secondary episodes of mechanical obstruction to volvulus of sigma resolved conservatively, whose first episode of volvulation occurred in the third month of her pregnancy.
A scheduled laparoscopic sigmoidectomy was performed. The first surgical step was placing a Faucher tube to decompress the colon, which allowed to safely perform a laparoscopic intervention. It also allowed undergoing a primary end-to-end mechanical anastomosis and avoiding the performance of a colostomy in a such a young patient.
Results: The patient presented a favorable clinical course without associating complications. She was discharged on the fourth postoperative day, asymptomatic at the time of release from the hospital and in the ambulatory control at 3 postoperative weeks, without signs of recurrence.
Conclusions: Colon volvulus is an entity that can be managed conservatively if the patient does not associate signs of ischemia or perforation. Its recurrent nature poses the need of using surgical techniques to avoid complications related to the appearance of new episodes.
In selected cases, added to process of optimization and pre-habilitation, decompression of the volvulated colon by intracolonic tubes allows performing a scheduled minimally invasive intervention, with all the advantages that these entail, and a higher rate of successful primary anastomoses.
Colorectal—benign
V174—- Laparoscopic treatment of acute appendicitis in pregnancy
Juan Sebastian Malo Corral, I. Fraile Alonso, Z. De Julian Fernandez, J. Hernandez Gutierrez, A Trinidad Borrás
Complejo Hospitalario Universitario de Toledo, General and Digestive Surgery, Spain
Introduction: Acute appendicitis constitutes the most common cause of non-gynecological or obstetric-related emergency surgery during pregnancy. Previous recommendations, stated that surgical procedures should be avoid during the first or third trimester to minimize the risk of spontaneous abortion and preterm labor, respectively. Nonetheless, were not supported by good quality evidence. Recent literature has demonstrated that pregnant women can undergo laparoscopic surgery safely during any trimester without an increased risk to the mother and fetus. There is no role for non-operative management of uncomplicated acute appendicitis in pregnant women because of a higher rate of peritonitis, fetal demise shock, and venous thromboembolism as compared to operative management. Recent evidence for the use of antibiotics alone for treating acute appendicitis has not been extended to the gravid patient.
Objective To demonstrate the safety and efficacy of laparoscopic approach using different trocar placement for acute appendicitis during pregnancy.
Mmaterials and methods: Patient is a 33-year-old female currently 29 + 3 weeks pregnant. Presented with a 24 h history of right flank pain. On physical exam, right flank and right upper quadrant tenderness. Abdominal ultrasound showed findings consistent with acute appendicitis with associated free fluid.
Results: Given the presentation surgical management was proposed. Gynecological consultation was requested with preoperative fetal monitoring within normal limits. Complete laparoscopic approach with three trocars (image 1) with findings of acute non perforated appendicitis and moderate amount of surrounding and pelvic free fluid. Appendectomy with resection at its base using a 45 mm yellow endoGIA.
In the immediate postoperative period, patients presented increased uterine dynamics which subsided with medical treatment and discharged on post operative day four.
On 30 day follow up, the patient has presented no surgical or obstetric complications.
Conclusions: Laparoscopic appendectomy with variation of trocar placement is a safe and effective approach for the treatment of acute appendicitis during pregnancy.
Colorectal—benign
V193—Necrotic appendicular base could be safely buried laparoscopically, using the standard three port by utilising the tumble knot configuration
Samer Zino
Ninewells Hospital, General Surgery, United Kingdom
Laparoscopic appendicectomy (LA)is the standard treatment for acute appendicitis. However, Laparoscopic management of difficult necrotic appendicular base could be very challenging.
In open surgery burring the appendicular was a safe surgical option.
Aims: To describe a safe technique that allow burring the necrotic appendicular base laparoscopically using the standard three ports.
Methods: This video describes how to bury the appendicular base laparoscopically using the standard three port. Prospectively collected data for patients who required laparoscopic burring of their necrotic appendicular base over the study period were analysed.
Result: To bury the appendix-base laparoscopically. 1-The appendicular-base is assessed to see if it could be invaginated safely into the caecum. 2- caecal mobilisation occasionally is required to facilitate the invagination process. 3- A standard purse-string stitch is performed starting from the anterior tinea using 3.0 or 2.0 absorbable stitch.4-The first two knots are configured as a tumble knot to allow tightening with one hand. 5- One hand invaginate the appendicular base inside the caecum while the knot is tightened by pulling the thread vertically using the other hand.
6-After ensuring that the base is buried the tumble knot is locked and another one or two secure knots are added.
104 patients required laparoscopic-appendicectomy only 8 (7.7%) patients required burying appendicular base due to necrosis or doubt about its integrity. Average age was 18y (18 – 72), 6 patients were females. All patient treated with IV antibiotic for at least 48 and completed an oral course for 7 to 10 days. Average post-operative stay was 4 days (2–7), average of total hospital stay was 5.7 days (4–8). Drain was used in one patient.Two patients underwent post-operative CT as CRP increases to > 350. Both CTs showed post-operative changes with no evidence of any complication or abdominal collection. There was no readmission or complication.
Conclusions: This study describe as safe technique to burry a necrotic appendicular base laparoscopically without adding extra port. This was possible by utilizing the tumble knot configuration. All patients treated in this study has good recovery and no post-operative complications.Therefore, we describe a surgical technique that could be utilised in managing necrotic appendicular base without the need to staple cut the caecum or convert to open surgery to bury the base.
Colorectal—benign
V194—Combined laparoscopic extirpation of a benign multicystic peritoneal mesothelioma and a urachal cyst
Marijus Ambrazevicius1, M. Kalinauskaite2, V. Vilius1, P. Vaitiekunas1
1Klaipeda Republican Hospital, Department of Abdominal and Endoscopic Surgery, 2Vilnius University, Faculty of Medicine, Lithuania
Aims: Benign multicystic peritoneal mesothelioma (BMPM) is a very rare disease with an annual incidence of 1,5–2 in 1,000,000. It usually occurs in reproductive age women and may be associated with endometriosis, pelvic inflammatory disease and previous surgery. A urachal cyst occurs when the foetal urachus fails to obliterate completely. Urachus abnormalities are rare in adults and urachal cysts usually manifest when infected.
Methods: A 35-year-old female presented to the consultation clinic with right iliac region pain lasting for about 1 year. Previous gynaecological examination found no ovary pathology and the patient had no previous surgery. Abdominal ultrasound showed a local fluid collection medial to the ascending colon indicating a cyst and suspicion of an urachal cyst. CT showed a collection of clear fluid intraperitoneally along the right lateroconal fascia bellow the liver—most likely a peritoneal cyst, and a cystic mass anterior to the urinary bladder – most likely a urachal cyst. Both cysts were resected laparoscopically and sent for pathological examination. Intraoperatively, the peritoneal cyst was located on the right parietal peritoneum. Pathology reported a BMPM (alternatively, “multilocular peritoneal inclusion cyst “) and confirmed a urachal cyst. The patient was discharged with no complications and a recommendation for future follow-up.
Results: Owing to the rarity of BMPM, with only around 200 cases reported world-wide, many surgeons might not recognize the possibility of recurrence or malignant transformation. Most BMPMs are incidental findings and usually arise from the pelvic peritoneum. In this case, the patient experienced pain and the mass was located on the anterior abdominal wall, which is atypical. Malignant peritoneal mesotheliomas are much more common, so any peritoneal mass should be examined for malignancy. The definite diagnosis is made solely based on histology. Treatment of BMPM ranges from observation to complete surgical resection or, in cases with incomplete resection and a high chance of local recurrence, cytoreductive surgery and hyperthermic intraperitoneal chemotherapy. As for treating urachal cysts, complete excision is recommended due to risk of malignancy. As most urachal cysts manifest with infection, a two-stage approach (incision and drainage followed by secondary excision) leads to less complications. In this case, the urachal cyst was found incidentally, and a single-stage excision yielded excellent results.
Conclusions: We present a case of a female patient with a BMPM and a urachal cyst – two rare pathologies. With complete surgical resection chances of BMPM recurrence are low and with follow-up should be caught promptly.
Colorectal—IBD
V177—Pouch preservation in case of vascular complications in one-stage ileal pouch anal anastomosis (IPAA) surgery
Carolina González-Abós, Y. Guzmán, A.M. Otero, R Bravo, AM Lacy
Hospital Clinic de Barcelona, Gastrointestinal Surgery Department, Spain
Aims: Ileal J-pouch has demonstrated superior function over other pouch configurations. Despite of that total proctocolectomy with ileal pouch anal anastomosis (IPAA) is a difficult technic with high rate of anastomotic complications. In this video we want to show some solutions in case of intraoperative complications in IPAA creation.
Methods: We present the case of a 40 year-old woman with a ulcerative colitis refractory to medical treatment. One-stage IPAA surgery was performed; the proctocolectomy was performed by hybrid approach (laparoscopic + transanal approach) without incidences. Ileal J-pouch was created with 3 firings of mechanic stapler with correct vascularization supply demonstrated by ICG fluorescence imaging. Laparoscopy was restarted and ileo-anal latero-terminal anastomosis was performed with circular endostapler. Once the anastomosis was created, ischemia of the pouch was observed with no vascularization evidence with ICG assessment. The presence of a bulky meso create tension once anastomosis was performed and vascularization was compromised. The anastomosis was undid and a pouchstomy, connecting the distal site of the pouch with the skin in right flank, was performed.
Results: After 11 months the patient had lost 15 kg due to physical activity and diet. Transit reconstruction was indicated and hybrid approach (laparoscopic + transanal approach) was performed. ICG vascularization assessment showed correct vascularization in the whole pouch and no difficulties were seen for pouch mobilization to the pelvis. Manual latero-terminal ileo-anal anastomosis was performed with no incidences. Correct vascularization was maintained after the anastomosis creation and there was no tension, a lateral ileostomy was performed.
No complications were seen in the postoperative period. The patient was discharged in the 3rd postoperative day.
Conclusion(s): ICG assessment is a good tool for vascularization assessment in difficult cases. The option of creating a “pouchstomy” allows us to avoid new bowel resection and makes possible to redo ileo-anal anastomosis in the future.
Colorectal—IBD
V178—Emergency laparoscopic subtotal colectomy for IBD—a three stage approach with trainee operating
Ken Campbell, Angelos Pazidis, R. Shaalan
Ninewells Hospital & Medical School, Colorectal Surgery, United Kingdom
Emergency laparoscopic subtotal colectomy for fulminant colitis is regularly required as an emergency procedure. It is a valuable procedure for training in minimal access approaches to the colon. This video illustrates a three stage approach highlighting where the technique is similar to and where it differs from cancer surgery.
The case is a 27 year old man with acute presentation of ulcerative colits who failed to settle on maximal medical therapy. The surgery is performed by a trainee under supervision. Areas of debate are highlighted.
Colorectal—IBD
V195—Three ports laparoscopic assisted right hemicolectomy for Crohn's disease of ileocaecal junction
Aleksandar Gluhovic, U Milosevic
Clinical Centre of Vojvodina, Clinic for abdominal and endocrine surgery, Serbia
Aim: The aim of this presentation is to present laparoscopic assisted right hemicolectomy with three ports and small transverse periumbilical laparotomy for removal of specimen and creating ileocaecal end to end anastomosis, for s Crohn’s disease of ileocaecal junction.
Method: Ten young patients during the period 2016–2019 with colonoscopy and abdominal CT confirmation of stenotic ileocaecal junction, caused by Crohn’s colitis, are subjected to laparoscopic assisted right hemicolectomy. Seven male and three female patients, previously treated conservatively, aged 22 to 30 years, were admitted to surgical department day before the surgery, after endoscopic examination and confirmation of ileocaecal stenosis. None of them didn’t received any mechanical bowel preparation, enemas or laxatives. Per oral nutrition were stopped at midnight, nine to twelve hours’ prior the operation. Antibiotic prophylaxis started one hour before surgery with Cephalosporin I’st generation and Metronidazole. Laparoscopic part of operations was conducted through trans umbilical 10 mm optical port, 10 mm left epigastric, and 5 mm left hypogastric port, dissection device used were Harmonic scissors and ligation of ileocaecal vessels were done with standard titanium clips. Specimen extraction site were small, 4 to 5 cm long transverse right periumbilical laparotomy with transection of rectus muscle. All ileocaecal anastomoses were open hands sewn, end to end continuous suture in one layer. Mobilization of patients started two to five hours after the surgery, postoperative per oral nutrition were initiated at day one, abdominal drain removal at day one or two.
Results: All these five young patients were discharged on postoperative day 3 or 4. We didn’t have any postoperative readmissions or early postoperative complications. All operations were performed by the same surgeon and one cameraman. Operative time were 55 to 90 min. (average 65 min.). Blood loss were 30 to 50 ml (average 35 ml). Patients come to regular controls and we noticed no complications so far.
Conclusions: Laparoscopic assisted right hemicolectomy trough three ports, minimal transverse periumbilical laparotomy for specimen extraction and hands sewn end to end anastomosis is safe and feasible procedure for Crohn’s colitis of ileocaecal junction.
Colorectal—IBD
V196—Laparoscopic complete mesocolic excision & separate ligation of ileocolic vessels at origin for safe mesentery resection for ileocolic Crohn's disease
Dinesh Singhal, Nitin Vashistha
Max Super Speciality Hospital, Saket, Department of Surgical Gastroenterology, India
Background: Emerging evidence from observational studies suggests that complete mesocolic excision (CME) during surgery for Crohn’s disease (CD) may reduce recurrence. However one of the reservations against routine use of CME is that in advanced CD mesentery is frequently inflamed thickened and bleeds heavily during transection. Hence conventional surgical resection is performed close to the bowel wall leaving the diseased mesentery in situ.
We perform laparoscopic CME for patients with ileocolic CD. We however do not use energy source or en mass clipping for central vascular ligation. Instead, we secure the ileocolic artery and vein separately at their origin with dissection, individual ligation & division. With this technique, CME can be performed safely and in blood less field. A short video of our technique is presented.
Brief description: A patient in his early twenties presented with history of recurrent pain abdomen and after extensive investigations was diagnosed to have ileocecal CD. His symptoms persisted on medical therapy and later he developed sub-acute intestinal obstruction (Fig. 1). After resolution of obstruction on conservative management he was offered laparoscopic ileocolic resection with CME. Initial diagnostic laparoscopy was performed and omental adhesions were taken down. Subsequent to dissection of ileocolic artery and vein separately, they were divided between the clips with scissors without using energy device (Fig. 2). Medial to lateral dissection of mesocolon and right colon from retroperitoneum was performed as in standard CME. After complete mobilization, extracorporeal stapled transection and hand-sewn two layered, side to side ileocolic anastomosis was fashioned. Thus en bloc removal of the diseased bowel segment along with intact fascial coverage of the disease and all blood vessels, lymphatics, lymph nodes and fibro-fatty tissue was performed.
Conclusion: Laparoscopic complete mesocolic excision with separate ligation of ileocolic artery and vein at origin is a useful technique of safe mesentery resection for ileocolic Crohn’s disease.

Colorectal—malignant
V008—Laparoscopic posterior pelvic exenteration and lateral lymph node dissection: feasibility of MIS for Beyond TME resection
Swapnil Patel, V Sukumar, M. Kazi, J Gori, A Desouza, A Saklani
Tata Memorial Hospital, Colorectal Division, Department of Surgical Oncology, India
Introduction: Role of Minimally invasive surgery (MIS) for Beyond TME resections for locally advanced rectal cancers in under investigation and remains to be established.
Method: We present a video illustration of a 54 year lady with a locally advanced middle third rectal cancer involving the cervix with doubtful involvement of right ureter planned for sphincter saving posterior pelvic exenteration with a possible need for right ureteric resection and reimplantation. She received neoadjuvant 50.4 Gy radiation with concurrent capecitabine and was operated after 7 weeks.
Results: Standard five port laparoscopic approach for rectal resection was adopted. After completing the initial medial to lateral dissection and high ligation of inferior mesenteric artery, splenic flexure was mobilised. Initially, posterior pelvic dissection was done till the pelvic floor. This was followed by right lateral dissection and left lateral dissection sequentially. Right lateral node dissection was formed. Medial and lateral para-vesical spaces were defined and the ureter was dissected till the uretero-vesical junction. Similar dissection was done on the left side. Colpotomy was done and vagina was dissected off the rectal tube. Rectal tube was divided using an Endo-stapler at the level of the pelvic floor. Vaginal stump was closed and rectal anastomosis done using Knight-griffen technique. A covering ileostomy was made. The blood loss was 250 mL and operating time was 360 min. Final histopathology revealed residual poorly differentiated rectal adenocarcinoma, ypT3N0 (0/37 nodes) with all margins free of tumour. She was planned for adjuvant chemotherapy.
Conclusion: This video demonstrates the feasibility of laparoscopic approach in complex multi-visceral pelvic resection with oncological adequacy whilst also offering a chance at organ and function preservation.
Colorectal—malignant
V009—Endoscopic Vacuum Therapy for treatment of anastomotic leak after colrectal surgery
Matteo Di Giuseppe1, Gianluca Lollo2, F. Proietti3, F. Mongelli3, J.M.A. Toti1, D. La Regina1, D. Christoforidis3, .C De Maria2, G. Lollo2
ORBV—Ente Ospedaliero Cantonale—Ticino, 1Surgery, 2Digestive Endoscopy, 3OCL—Ente Ospedaliero Cantonale—Ticino, Surgery, Switzerland
Background: Anastomotic leak after colorectal surgery is a complication with a rate of 1% to 24% in different case series. Traditional treatment often involves reoperation to drain the pelvic cavity and to perform a loop ileostomy. The use of the exo-endo Sponge represents a new approach to this complication in selected patients. This video shows two cases of patients undergoing rectal surgery who developed an anastomotic leak.
Methods: The first case involves a 55-year-old woman who underwent laparoscopic resection of the high rectum and loop ileostomy, complicated by an anastomotic leak. Treatment with Eso Sponge was performed.Two pig tail drains were subsequently placed in the cavity.
The second case concerns an 88-year-old man who underwent laparoscopic rectal resection and loop ileostomy for a recurrent anastomotic rectal tumour, which had been resected a year earlier. The operation was complicated by an anastomotic leak, which was treated with Endo Sponge.
Results: Both patients recovered after 6 and 3 endoscopic treatments respectively. Control coloscopy demonstrated complete closure of the leak by granulation tissue formation.
Conlusions: In the cases presented, endoscopic treatment of the anastomotic leak after colorectal surgery was a safe and feasible treatment option.
Colorectal—malignant
V010—Ventral Suspension Using the Bilateral Sling Technique to Improve the Critical View in the Pelvis
Hisham Bakr, M Abdeldayem, A Wagstaff, A.G Masoud
Prince Charles Hospital, Colorectal Surgery, United Kingdom
Introduction: Laparoscopic views in the abdomen are excellent, however, the views within the confinements of the narrow pelvis, especially in males, are limited. In open surgery, the view in the pelvis can be improved using wide multiple retractors and the hands of the surgeon and his assistants. In laparoscopic surgery, on the other hand, being inherently minimal access procedures with fine instruments, similar views can only be achieved using multiple additional retractors, however, this requires many grappling ports and multiple assistants which is against the principle of minimally invasive surgery.
Aim: To demonstrate the use of the bilateral sling technique to improve the critical view in both the male and female pelvises.
Methods: 1.In the male pelvis.
Exposure of both seminal vesicles to free the peritoneal reflection.
A double ended straight needle is used for ventral suspension of the freed peritoneal folds.
The suspension significantly improves the views in the pelvis without the need for dedicated retractors to maintain the critical view.
This allows both the surgeon and his assistant to have free hands to continue the dissection in the deep pelvis.
The critical view is achieved by visualising.
-
i
The seminal vesicles.
-
ii
The prostate.
-
iii
The levator plate.
2. In the female pelvis.
Bilateral slings are used to ventrally suspend the round ligaments and retract the uterus anteriorly if fertility is a concern. Otherwise, the lateral ends of the fallopian tubes are better used as they help in ovarian retraction.
The improved view allows both the surgeon and his assistant to have free hands to continue the dissection in the deep pelvis.
The critical view is achieved by viewing.
-
i
The lower vagina.
-
ii
The levator plate.
d. An additional sizer in the vagina helps the dissection in the rectovaginal plane.
Results: This technique is simple, effective and time saving. It maintains a steady retraction throughout the deep pelvic dissection. It has consistently proved to facilitate the critical view required for safe completion of low pelvic resections.
Conclusion: The ventral suspension of the anterior pelvic organs using the bilateral sling technique is a safe and effective method to achieve the critical views in the deep pelvis and allow for ultra-low resections.
Colorectal—malignant
V011—Clinical case: Lynch syndrome. Multiple primary synchronous colon adenocarcinoma and pancreatic ductal adenocarcinoma
Nikita Pepenin, K. S. Burmich, K. O. Zadorozhna
MC Dobrobut/O. O. Bogomolets National Medical University, Oncological, Ukraine
Introduction: Colorectal cancer is the 3rd most common cancer and the 4th most common cause of death from cancer worldwide. At the same time, cancer of the pancreas is the 12th most common type of cancer worldwide and almost always leads to death. Although, the occurrence of primary multiple synchronous associated malignancies of these organs has been reported rarely.
Aim: The main goal of this study is to describe the rare clinical case of Lynch syndrome, associated multiple primary synchronous colon adenocarcinoma and pancreatic ductal adenocarcinoma.
Methods: A 62-year-old female presented with complaints of bloating, heartburn and pain in the right hypochondrium for the last 6 months and uterus extirpation in anamnesis. Colonoscopy has shown three lesions of caecum, ascending part and hepatic flexure of the colon. Biopsy revealed tubular adenoma, moderately differentiated (G2) adenocarcinoma and intramucosal adenocarcinoma, respectively. CT-scan showed pancreatic tail changes. MRI examination confirmed the neoplasm of the pancreas, compared to the mixed type intraductal papillary mucinous tumor. The case was surgically managed by performing the laparoscopic right extended colectomy and distal spleen-preserving pancreatectomy (Kimura operation) simultaneously.
Results: Histopathology of the extended right colectomy specimen confirmed the primary-multiple synchronous adenocarcinoma of the colon: moderately differentiated adenocarcinoma of the ascending colon (pT2), highly differentiated adenocarcinoma of the hepatic flexure (pT1) pN0(0/22)cM0 L0 V1 Pn0 R0; moderately differentiated intraductal tubulopapillary pancreatic adenocarcinoma (ITPN) pT1cpNx L1 V0 Pn0. Immunohistochemical results respond to the tumor with insufficiency reparation of complementarity errors/ microsatellite-unstable tumor (MMRd/ MSI-H: MLH1 + , PMS2 + , MSH2-, MSH6-), most likely due to germ mutations in the MSH2 gene, associated with Lynch syndrome. Final diagnosis: Lynch syndrome. Primary multiple synchronous adenocarcinoma of the ascending colon (pT2) and hepatic flexure of the colon (pT1)pN0(0/22)cM0; pancreatic tail adenocarcinoma pT1cpNx L1 V0 Pn0 (ITPN), cl. gr. III. Second-look diagnostic laparoscopy didn’t show any suspicious focuses; cytologically,—no signs of recurrence of the disease were detected. Six courses of adjuvant chemotherapy, according to the GEMCAP scheme, were prescribed and underwent by the patient.
Conclusion: The possibility of coexistence of multiple malignancies, during evaluation of one primary, should always be kept in mind. The main goal of management in cancer patients should always be curative. Even in the presence of multiple lesions.
Colorectal—malignant
V012—Laparoscopic extended right colectomy with CME and intracorporeal anastomosis
Andrea Biancucci, A. Fassari, M.M. Lirici
San Giovanni—Addolorata Hospital Complex, Department of Oncological Surgery, Italy
Aims: showing the technical steps of the laparoscopic approach to extended right colectomy with complete mesocolic excision (CME) for a stenosing cancer of the proximal transverse colon. The open procedure, first described by Hohenberger may be safely and effectively reproduced through a minimal invasive approach, with central vessel ligature (CVL) and radical lymphadenectomy.
Methods: A 55-year-old man with preoperative CT-scan and endoscopy showing a near-circumferential stenosing lesion of the transverse colon, 5 cm distal to the hepatic flexure. The procedure is accomplished through four ports, carrying out a caudal-to-cephalad dissection, starting with ileo-caecal mobilization according to Cattel-Braasch, approaching the ileocolic mesentery and dividing the distal ileum. The posterior dissection proceeds along the plane between the right Toldt and Gerota fasciae, freeing the lateral and anterior aspects of the duodenum. Then dissection is furthered on a caudo-cranial fashion along the root of mesocolon exposing the superior mesenteric vessels, up to the head of the pancreas. First, the ileocolic vein and artery are dissected free and divided then the mid-colic pedicle is approached and treated similarly, with central vessel ligature-division. The distal transverse colon is divided and the dissection of the gastro colic ligament with lymphadenectomy of right gastroepiploic artery performed to complete the extended right colectomy with CME. Once the left colonic flexure is mobilized, an ileo-transverse intracorporeal stapled anastomosis is fashioned.
Result: Post-operative course was uneventful, the patients was discharged on postoperative day 5. Histology findings demonstrate the presence of a pT3 N2a R0 adenocarcinoma with 6 out of 19 lymph nodes positive for metastasis.
Conclusion: Laparoscopic CME is feasible and safe, but needs extensive knowledge of the vascular anatomy as well as a step learning curve and advanced laparoscopic skills are required to accomplish such a challenging procedure.
Colorectal—malignant
V128—Transanal approach to the rescue: intraoperative distal margin salvage after laparoscopic total mesorectal excision for low rectal cancer
Romina Pena, FB De Lacy, G Chullo, S Valverde, AM Lacy
Hospital Clínic de Barcelona, Gastrointestinal Surgery, Spain
Aims: Total mesorectal excision can be performed via open, laparoscopic (LapTME), robotic, or transanal approach (TaTME). Several randomized controlled studies over the years have compared these strategies, proving them safe and effective. Nevertheless, TaTME offers the advantage of a comfortable pelvic dissection and good specimen quality, making it an ideal procedure for mid and low rectal cancer.
Methods: We present the case of a 47-yo woman, that presented with rectal pain. Colonoscopy showed an irregular lesion at 3 cm to 8 cm from anal verge in the anterior wall of the rectum, occupying half of the circumference. Pathology was positive for infiltrating adenocarcinoma. Initial MRI yielded a cT3N1 and control MRI after long-course chemoradiotherapy showed a good response with no infiltration of the sphincteric complex and no adenopathies. Patient was initially proposed for a low anterior resection with LapTME. The procedure was performed without complications and the specimen was extracted via Pfannenstiel. At macroscopic inspection, the distal margin seemed affected. Intraoperative pathology examination reported fibrotic changes, unable to rule out malignant infiltration since frozen section was not available. The surgical team decided to convert to a transanal approach to resect the rectal stump. Surgical team converted to a Cecil approach seamlessly, and a TaTME was completed. Finally, a coloanal anastomosis and loop ileostomy were performed.
Results: Operative time was 210 min. Postoperative period was uneventful, and the patient was discharged four days later. Final pathology report showed no evidence of tumor (ypT0N0). Two months after surgery, she is disease free and wait-listed for ileostomy closure.
Conclusions: The transanal approach is useful not only as a main operative strategy, but also as a salvage maneuver after a laparoscopic total mesorectal excision with affected distal margin. Recently, novel indications for the transanal approach, including close rectal dissection for ulcerative colitis and rectal stump dissection for Hartmann’s stoma reversal, have further proven this technique as a valuable part of the surgical armamentarium in rectal surgery. Nevertheless, recent evidence warns that TaTME should be performed in expert centers and requires extensive training in order to achieve acceptable results.
Colorectal—malignant
V129—Laparoscopic lateral pelvic lymph node dissection for anaorectal melanoma: a video vignette
Sanket Bankar, D. Pandey, V. Sukumar, S. Patel, J. Rohila, A.Desouza, A Saklani
Tata Memorial Centre, Surgical Oncology, Mumbai, India
Introduction: This video vignette demonstrates a stepwise approach to laparoscopic lateral pelvic lymph node dissection in a case of anorectal melanoma with enlarged lateral pelvic lymph nodes using a systematic sequential approach ensuring oncological adequacy at all times.
Objectives: To demonstrate a systematic approach to Laparoscopic Left Pelvic Lymph node dissection (PLND) for Anorectal Melanoma.
Material and Methods: A 53 year Gentleman presented to us with bleeding per rectum for 1 year duration. Digital rectal examination elicited a lesion 1 cm from the anal verge, revealing Melanoma on Biopsy. MRI Pelvis showed Polypoidal.
Lower rectal lesion 2 cm from anal verge with the involvement of Right external sphincter and left internal iliac and obturator Lymph nodes. Metastatic workup with Whole Body PET CECT was Normal. He was scheduled for Laparoscopic APR with Left PLND.
Results: The surgery was uneventful with an operative time of 210 min. The Blood loss was 200 ml. The postoperative course was uneventful.
Conclusions: The use of minimally invasive techniques including laparoscopy can greatly reduce the overall pain, hospital stay and postoperative complication in such patients. Additionally, the nodal clearance is improved by enhanced and magnified vision.
Colorectal—malignant
V130—Complete Mesocolon Escision Guided by Indocyanine Green for Right Colonic Cancer
JeanCarlos Trujillo-Díaz1, L. Pérez-Corbal2, I. Alarcón Del Agua3, E. Licardie Bolaños4, A. Senent Boza3, F. López-Bernal3, M. Socas Macías3, S. Morales-Conde3
1Valladolid Clinic University Hospital, General And Digestive Surgery, 2Complejo Hospitalario Universitario De Pontevedra, 3Hospital Universitario Virgen Del Rocío—Sevilla, 4Hospital Quirón Salud Sagrado Corazón—Sevilla, Spain
Aims: Complete mesocolon excision and D3 lymphadenectomy have been shown to provide superior oncological outcomes and better survival advantages in patients with right colon cancer stages I-III. Lymphatic flow for tumors located in the hepatic flexure can vary and can be uncertain. Therefore, an intraoperative real-time laparoscopic observation of the lymph flow of this area using indocyanine green (ICG) fluorescence imaging can be helpful for identifying appropriate central vessels to be dissected and for determining the appropriate surgical plane of the mesentery.
Methods: Video-case presentation.
Results: We present a video case of a 46-year-old male. No pathology history or prior surgeries. The patient had a history of lower right quadrant abdominal pain, which led to perform an abdominal CT and colonoscopy showing a non-occlusive tumor of 5 cm near the hepatic flexure with a histopathology of adenocarcinoma. CT scan: tumor of approximately 5 cm located in the proximal transverse colon with colonic wall thickening and 2 lymph nodes suspicious of malignancy in the mesocolon, no distant metastatic lesions. cT3N1M0, Stage IIIB.
A laparoscopic right colectomy with complete mesocolon excision and D3 lymphadenectomy was planned. The surgical procedure was performed with the patient in supine position, with 4 trocars inserted. The surgery begin by identifying the tumor which is in the transverse colon, near the hepatic flexure. A catheter connected to a needle was introduced and proceed to inject ICG into the wall of the colon (subserous layer). While the ICG flows through the lymphatic channels, approximately 15–20 min, the dissection begins through a cranial approach. The dissection continues with the mobilization of the hepatic flexure. We change from a cranial to middle approach: the dissection begins just above the superior mesenteric vein, performing a carefully lymphadenectomy at this level. We continue the dissection of the ileocolic vessels changing to ICG mode to try to identify lymph nodes at this point. We continue the lymphadenectomy above all the superior mesenteric vein until the origin of the Henle´s Trunk. We dissect the right colic vein being transect it with Ligasure. The dissection continues medial to the superior mesenteric vein looking for the middle colic artery. At this level we change to ICG mode to guide the lymphadenectomy. At this level the ICG fluorescence imaging guided the lymphadenectomy. We can observe some lymph nodes around the left branch of the middle colic artery stained with ICG. One the proper lymphadenectomy is performed at the origin of the middle colic artery and its left branch, the right branch is transected by Ligasure. Finally, we complete the surgery by performing an intracorporeal ileo-colic anastomosis.
The patient had a postoperative paralytic ileus without another complications. He presented a satisfactory evolution, with improvement in abdominal pain, good oral tolerance and good intestinal transit. The histological study confirmed a pT3N1b (IIIB stage) adenocarcinoma.
Conclusions: Optimal lymphadenectomy with complete mesocolon excision has an important impact on the oncological outcomes after a right-sided colon cancer surgery. For hepatic flexure tumors, the ICG fluorescence imaging can improve the performance of more radical D3 lymphadenectomy. ICG fluorescence could has a role on determining the appropriate surgical plane of the mesentery in complete mesocolon excision.
Colorectal—malignant
V131—Laparoscopic chronic presacral sinus repair with anastomotic preservation after rectal cancer surgery
Yoelimar Guzman, C. Gonzalez, A. Otero-Piñeiro, R. Bravo, F. De Lacy, A. Lacy
Hospital Clínic de Barcelona, General and digestive surgery, Spain
Aims: significant advances have been achieved in the treatment of rectal cancer over the past three decades. Nevertheless, regardless of the surgical approach, perioperative complication rates are still high. Anastomotic leakage (AL) is a potentially devastating complication which may result in severe morbidity and mortality, as well as long-term sequelae such as chronic sinuses, which often require an intersphincteric proctectomy or an anastomotic redo for definitive management. This video aims to present the case of a laparoscopic chronic presacral sinus repair with circular anastomotic preservation.
Methods: a 68-year-old female with no known comorbidities underwent a low anterior resection for rectal cancer located 5 cm from the anal verge in June 2019, after receiving neoadjuvant therapy. A side-to-end handsewn anastomosis and a defunctioning ileostomy were performed. The patient presented an AL at the level of the transverse stapling line of the colonic stump, with an intact circular anastomosis. She was initially managed with endoscopic placement of vacuum sponges (Endosponge®) and early surgical closure, although complete anastomotic healing was not achieved and patient developed a chronic sinus. Given the sufficient length of the efferent colonic limb, a laparoscopic colonic stump resection with preservation of the circular anastomosis was attempted.
Results: the total operative time was 120 min. The patient started oral intake 6 h after surgery and was discharged 48 h later. Water-soluble enema revealed no leakage and an early closure of the defunctioning stoma was performed 3 weeks after the intervention, with no postoperative events. Currently, the patient is asymptomatic, and with adequate health-related quality of life and functional outcomes.
Conclusion: the treatment of a chronic presacral sinus is challenging and often requires major surgery. However, the anastomosis may be preserved in selected cases. Therefore, it is important for these patients to be treated in high-volume expert centers.
Colorectal—malignant
V132—Lymphatic drainage in splenic flexure cancer: evaluation with indocyanine green fluorecence during laparoscopic splenic flexure resection
Maria Francesca Chiappetta, Ludovica Baldari, C. Frattaruolo, D. Moioli, C. Bertani, L. Baldari, E. Cassinotti, L. Boni
University of Milan— Fondazione IRRCS Ca Granda, Ospedale Maggiore Policlinico., General Surgery, Italy
Aim: Splenic colon surgery has not a standardized approach. Cancer of this area could have variable lymphatic drainage and the exact site of lymphatic dissection is uncertain. This video shows the use of indocyanine green fluorescence to map lymphatic drainage in splenic flexure cancer.
Methods: The patient is a 64 years old woman. She had a substenosing cancer of splenic flexure diagnosed with colonoscopy performed after positive to fecal occult blood test (FOBT). She was placed in supine position. 4 trocars were placed: 1 of 10 mm in mesogastrium, 2 of 5 mm in right hypocondrium and in left one and 1 of 12 mm in right flank. We injected indocyanine green (5 cc) into the submucosal layer around the tumor. We started dissection and isolated inferior mesenteric artery (IMA) and left colic artery (LCA) that was ligated at the root. We continued colic mobilitation along Toldt fascia. After this we isolated inferior mesenteric vein (IMV) that was ligated at the root. We completed transverse mesocolon dissection along gastric wall and pancreatic one. After approximately 30 min, observed lymph flow using the laparoscopic near-infrared camera system: tumor drainage followed left branch of medial colic vein that was isolated and ligated. We ended with section of gastrocolic ligament. After injection of 4 cc of indocyanine green and valuation of colon vascularitation, we dissected splenic flexure with mechanical stapler. Overwising of colonic stumps. A lateral-lateral intracorporeal anastomosis was performed. Mesentery closure. At the end of surgery we evaluated specimen and lymph nodes drainage.
Results: The postoperative course was uneventful and the patient was discharged on postoperative day 5. Final pathological examination showed pT3,N0 (0/43 nodes G2).
Conclusion: Indocyanine green fluorescence could help in lymph nodes dissection in cancer of splenic flexure.
Colorectal—malignant
V133—Neoadjuvant Radiotherapy and Laparoscopic Selective Lateral Pelvic Lymph Node Dissection: our strategy for Advanced low rectal cancer
Shuichiro Matoba, H. Kuroyanagi, S. Toda, Y. Hanaoka, K. Hiramatsu, F. Fukui, Y. Maeda, M. Ueno
Toranomon Hospital, Gastroenterological Surgery, Japan
Background: In general, rectal cancer surgery is technically demanding due to requirement of manipulation in narrow pelvic cavity. The pelvic cavity is too narrow to be able to see clearly when the open surgery is performed. With the recent development of laparoscopy, especially 3D laparoscopy, the optimal visualization has been so Laparoscopic Surgery was introduced to rectal cancer.
There is different in the treatment of low advanced rectal cancer between the Western countries and Japan. The standard treatment for advanced low rectal cancer in Westrn Countries are Neoadujvant Radiotherapy(NART) followed by Total Mesorectal Exicision(TME). Recently, it was shown that lateral pelvic recurrence after NART was the major cause of local recurrence by some reports. We thought that it was not enough NART and followed TME in case lateral pelvic lymph node (LPLN) metasatasis, so our stetoragy of advanced lower rectal cancer was NART and followed by laproscopic TME when LPLN metastasis was suspected, laparoscopic LPLN dissection (LPLD) was perfomed. We investigate safety and feasibility of our strategy.We have been performed neoadjuvant radiotherapy (NART) for clinical Stage II or III low rectal cancer since 2010. LPLD is selectively performed only for the side of a swollen lymph node defined as 7 mm or larger in long axis. LPLD with en-bloc resection of internal iliac vessels or pelvic plexus is preoperatively planned in a tailor-made manner according to imaging studies. All procedures are performed laparoscopically.
Patients and Methods: From April 2010 to December 2015, 161 patients with advanced low rectal cancer underwent curative surgery after NART. Long-course NART (45 Gy) is generally selected, however short-course NART(25 Gy) is chosen depending on individual circumstances. LPLD was performed even for the patients whose LPLN was decreased after long-course CRT. We performed using 5 port and a 10 mm flexible scope. We investigated 161 patients divided into 2 groups, enlarged LPLN(Enlarged Group) and non-enlareged LPLN(Non-Enlarged Group), respectively.
Results: There was no open conversion. Enlarged Group was 63 patients and LPLD was performed for 61 patients.Non- enlarged group was 99 patients. Median operative time was 466 and 312 min, Median blood loss was 72.5 ml 50 ml respectively. Pathological stages of Enlarged Group included 3 ypStage0, 13 StageI, 18 ypStageII, 29 ypStageIII. LPLN metastasis was pathologically proven in 18 patients (6.8% of whole patients and 28.6% of Enlarged Group). Pathological stages of Non-Enlarged Group included 7 ypStage0, 30 StageI, 39 ypStageII, 22 ypStageIII.
Postoperative complications greater than Clavien-Dindo grade III of Enlarged Group was 3 patients 5%, Non- enlarged group was 2 patients 1.9%.
Recurrence was detected in 34 patients(21.1%). Overall local recurrence of Enlarged Group and Non-Enlarged Group was detected in 9 cases(5.6%) and 3 cases(3.1%).
Conclusion: Our treatment strategy for low rectal cancer is safe and oncologically feasible.
Colorectal—malignant
V134—Endoscopic Vacuum Therapy for anastomotic leakage after colorectal surgery: a video vignette
Matteo Di Giuseppe1, C. De Maria2, . Spampatti1, F. Mongelli3, D. La Regina1, J.M.A. Toti1, D. Christoforidis3, P Majno-Hurst3, G. Lollo2
Ospedale Regionale di Bellinzona e Valli, 1Surgery, 2Gastroenterology, 3Ospedale Regionale di Lugano, Surgery, Switzerland
Background: Anastomotic leakage (AL) following colorectal surgery occurs in 1% to 24% of cases. Traditional treatment often involves reoperation to drain the pelvic cavity and to perform a loop ileostomy. The endoluminal vacuum therapy is used to salvage anastomosis in a minimal invasive approach.
We present the cases of two patients with AL after rectal resection treated with endoluminal vacuum therapy avoiding the need for further surgery.
Materials and Methods: Two patients with anastomotic leaks following rectal surgery were treated at our Institution with Eso-SPONGE® (B. Braun Melsungen AG, Melsungen, Germany) with a variable negative pressure of 50 to 75 mmHg. The Eso-Sponge system was replaced every 48–72 h until complete closure of the defect with granulation tissue.
The first case (Video 1) describes the history of a 55-year-old woman who underwent a laparoscopic anterior resection of the rectum and loop ileostomy, complicated by an anastomotic leak. An endoscopic vacuum therapy was initially performed and then combined with the subsequent application of two pigtail in the wound cavity.
The second case (Video 2) describes the history of an 88-year-old man who underwent laparoscopic rectal resection and loop ileostomy for recurrence at the anastomosis after sigmoid resection a year earlier. The operation was complicated by an anastomotic leak, which was treated with Endo Sponge.
Results: Both patients recovered after 6 and 3 endoscopic treatments respectively. Control coloscopy demonstrated complete closure of the leak by granulation tissue formation.
Conclusions: In the cases presented, endoscopic treatment of the anastomotic leak after colorectal surgery was a safe and feasible treatment option.
Colorectal—malignant
V135—Interactive 3d vascular reconstruction: a navigation tool to improve safety in D3 right colectomy
Jeancarlos Trujillo-Díaz1, L. Pérez-Corbal2, I. Alarcón Del Agua3, E. Licardie Bolaños4, A. Senent Boza3, F. López-Bernal3, M. Socas Macías3, S. Morales-Conde3
1Valladolid Clinic University Hospital, General And Digestive Surgery, 2Complejo Hospitalario Universitario De Pontevedra, 3Hospital Universitario Virgen Del Rocío—Sevilla, 4Hospital Quirón Salud Sagrado Corazón—Sevilla, Spain
Aims: D3 lymphadenectomy have been shown to provide superior oncological outcomes and better survival in patients with right colon cancer stages I-III. However, this procedure is technically challenging and could carry the risk of major complications. Furthermore, there is a variety of vascular anatomical variants that can make this type of surgery even more difficult. Hence the importance of presenting this video where we emphasize the importance of preoperative 3D vascular reconstruction, which helps us to plan the surgery and to identify the relationships between the tumor and the adjacent structures and mainly to identify the vascularization and its anatomical variations, becoming a guide during surgery, improving safety during complex right colectomy with D3 lymphadenectomy.
Methods: Video-case presentation.
Results: We present a video case of a 79-year-old female with a history of anemia, which led to a diagnostic colonoscopy revealing a cecal adenocarcinoma. Preoperative three-dimensional (3D) vascular reconstruction was performed, where we can observe anatomical vascular variations such as common trunk of the right colic and ileo-colic arteries. Laparoscopic right colectomy with D3 lymphadenectomy was planned.
The surgical procedure was performed with 4 trocars with the patient in supine position. We performed a cranial approach of the middle colic vessels, it begins with the transection of the gastro-colic ligament and continues with mobilization of the hepatic flexure. We continue with a careful dissection on the Henle trunk area. We change from the cranial to the middle approach: The dissection continues following the path of the vessels to their origin (superior mesenteric vein and artery). We performed the dissection of the ileocolic vessels and finally section it with Ligasure. In the 3D reconstruction, we can see a common trunk between the ileocolic artery and the right colic artery. We perform the lymphadenectomy at this level and dissect them separately. We continue the lymphadenectomy above all the superior mesenteric vein path until the Henle´s trunk area. In the 3D vascular reconstruction, the three veins of the gastrocolic trunk of Henle (right gastroepiploic vein, pancreaticoduodenal vein and right colic vein) are observed which flow into the superior mesenteric vein. Next step is the dissection and lymphadenectomy of the middle colic vessels. The cranial approach allows us to have control of the pancreas. We complete the surgery by performing an intracorporeal side-to-side ileo-colic anastomosis. We don’t close the mesenteric defect and don’t leave intra-abdominal drainage.
The patient had a postoperative paralytic ileus without another complications. She presented a satisfactory evolution, with improvement in abdominal pain, good oral tolerance and good intestinal transit. The histological study confirmed a pT3N0 adenocarcinoma.
Conclusions: D3 lymphadenectomy are technically challenging and could carry major complications. There is a variety of vascular anatomical variants in the righ colon that can make this type of surgery even more difficult. Preoperative 3D reconstruction helps us to plan the surgery by identifying the vascularization and its anatomical variations, so it can serve as a guide during surgery, thus improving safety during complex right colectomy with D3 lymphadenectomy.
Colorectal—malignant
V136—Laparoscopic segmental resection with D3 central lymphadenectomy for cancer of the transverse colon
Vasile Bintintan1, V. Fagarasan2, R. Chira1
1University of Medicine Cluj Napoca, Chirurgie, 2Spitalul Clinic Judetean Cluj, Clinica Chirurgie I, Romania
Introduction: Laparoscopic radical resection of tranverse colon cancer is rarely performed due to lack of standardisation of the technique and difficulties in performing a proper central lymphadenectomy.
Material and method: A 65 years old obese patient with a malignant tumor of the transverse colon and enlarged lymph nodes along the middle colic artery branches was operated using a medial-to-lateral, central lymphadenectomy laparoscopic technique. The middle colic artery and vein were divided at their origin from the superior mesenteric vessels, a central lymphadenectomy was performed, the root of the transverse colon was dissected from the pancreatic fascia and, after resection, the colo-colic anastomosis was performed using an intracorporeal suturing technique. The video presented demonstrates clearly all these steps.
Results: The postoperative course was uneventful, the patient was discharged in the 4th postoperative day. The pathological report confirmed presence of large resection margins and identified 28 lymph nodes on the resected specimen.
Conclusions: Laparoscopic radical resection with complete mesocolonic excision is possible in experienced hands even for tumors located in the transverse colon, with all the benefits of a minimally-invasive surgical technique.
Colorectal—malignant
V161—A locally advanced sigmoid cancer infiltrating adjacent organs—multivisceral laparoscopic resection
Tomasz Wikar
Jagiellonian University Hospital, 2nd Department of Surgery, Poland
A locally advanced sigmoid cancer infiltrating adjacent organs is currently still an indication for an open resection and a common reason for conversion if diagnosed intraoperatively during laparoscopic surgery. It results in depriving those patients of the well-established advantages of laparoscopic surgery. We present a case of a 58 years old male (BMI 22.4 kg / m2) with the obstructing sigmoid malignant lesion. The preoperative, staging computed tomography showed a tumour infiltrating pelvic organs including bladder, small intestines, vas deferens and the appendix. The patient was scheduled for laparoscopic resection. The postoperative course was uneventful and the histopathological result confirmed R0 resection.
The video presents the technique of a laparoscopic multivisceral resection for the locally advanced sigmoid cancer including partial bladder wall resection with its reconstruction as well as shows the advantages of both, the lateral sigmoid dissection and the medial to lateral approach in mesentery dissection in case of a shortened sigmoid mesentery.
Colorectal—malignant
V162—Negotiating the vasculature of the right colon when performing laparoscopic CME and CVL—the central role of pre-operative contrast CT scans
Ken Campbell, D. Ziyaie, D. Porter, S. Sharma, A. Pazidis
Ninewells Hospital & medical School, Colorectal Unit, United Kingdom
Complete Mesocolic Excision with Central vascular Ligation may represent a more oncologically sound procedure for right sided colon cancers. Widespread adoption has been hindered by the perception that it is a more complex procedure associated with increased morbidity. Vascular injury is the most feared complication and the variability of right sided vascular anatomy is a contributory factor.
This video is a compilation of cases demonstrating a variety of vascular arrangements and the predictive value of careful pre-operative CT road mapping.
Colorectal—malignant
V163—Complete vascular preservation of inferior mesenteric vein and artery (CoVaP) in left laparoscopic hemicolectomy for adenocarcinoma
Cecilia Ferrari, L. Dova, B. Palermo, A. Filippelli, M. Saracco, A. Gennai, A. Cadeo, P. Bonfante, A. Bianco, C. Bianchi, S. Berti
Hospital S. Andrea, General Surgery, Italy
Background: Anastomotic leakage still represents a complication of colorectal surgery that can seriously compromise post-operative course. In the last years new techniques to study the vascularization of colonic stump emerged (i.e.: indocyanine test) that nowadays are considered a standard to control quality of anastomosis.
Case presentation: We present a case of a 64 years old man with cancer of proximal descending colon. The patient anamnesis was characterized by a previous gastric by-pass with open approach. The neoplasia was located in the proximal portion of descending colon and preoperatory biopsy reported infiltrating adenocarcinoma moderately differentiated. Oncological markers were negative. An elective laparoscopic surgery was planned. The first part of operation was dedicated to lysis of adhesions of the previous open bariatric surgery. We positioned camera trocar two cm on the right side of umbilicus, one trocar in right iliac fossa, one trocar on the left flank and one trocar in epigastrium. We continued the procedure opening the left parietocolic recess with the identification of left ureter. We identified inferior mesenteric artery (IMA) and we proceed to the dissection of arterial lymphatic tissue bottom –up from its rooth. The IMA peeling allowed us to isolate the branches included in the resection: left colic artery (LCA) and tributary artery of splenic flexure of colon (SFA). LCA and SFA were sectioned between clips with preservation of IMA, and inferior mesenteric vein (IMV) was isolated and preserved too. Colon was sectioned between mechanic stapler and L-L anastomosis was made, indocyanine test showed regular vascularization. Surgical specimen was delivered with endo-bag from Pfannensteil incision. Post-operative course was characterized by complication Clavien Dindo I and patient was discharged on VIII post-operative day.
Conclusions: The optimal extent of mesenteric resection for splenic flexure or proximal descending colon cancer is still an open discussion. This topic has to be reconsidered and related to the quality of colonic stump and, of course, to the risk of anastomotic leakage. The preservation of inferior mesenteric artery and inferior mesenteric vein is feasible and could improve vascularization and reduce risk of edema of colonic stump.
Colorectal—malignant
V164—Difficult Laparoscopic pelvic lymph node dissection following a dose of boost radiotherapy in a case of locally advanced rectal cancer
Vivek Sukumar, A. Saklani, A. Desouza, M. Kazi, J. Gori
Tata Memorial Hospital, Department of Surgical Oncology, India
Introduction: Total mesorectal excision is the gold standard for treating middle and low rectal tumours, including removing all lymph nodes in the mesorectum, resulting in improved pathological and oncological outcomes. The management of spread in the lateral pelvic lymph nodes differs in Western and Japanese guidelines, with the former considering it to be an advanced form of the disease and the latter considers it to be a local disease treated with lymph node dissection with or without neoadjuvant treatment. Recently there has been increasing use of additional radiotherapy in the form of boost and standard neoadjuvant chemoradiation.
Purpose: We aim to demonstrate a difficult laparoscopic pelvic lymph node dissection along with Abdominoperineal resection in a case of locally advanced rectal cancer. The video shows the surgeon's difficulties and challenges while performing a pelvic lymph node dissection after the patient has received an additional boost of radiation.
Materials and Methods: A 66-year-old lady presented to us with locally advanced rectal cancer. Pre-operative imaging revealed enlarged left obturator nodes. She received boost radiation consists of 5 fractions of 3 Gy (Total 15 Gy delivered to the tumour additional to standard chemoradiation of 50 Gy with Capecitabine. She then underwent laparoscopic abdominoperineal resection with pelvic lymph node dissection and V Y Plasty.
Results: The postoperative course was uneventful, and she was discharged on the 5th postoperative day. The postoperative histopathology revealed viable residual adenocarcinoma. All margins were free of tumour.
Conclusions: The role of lateral lymph node dissection remains a matter of debate. The emphasis lies in identifying pelvic lymph nodes preoperatively and using lateral lymph node dissection in a select group of patients who may benefit from the procedure. Minimally invasive approaches may be used to perform pelvic lymph node dissection. The use of boost radiation makes the procedure more challenging, and longer learning curves may be required to perform safely.
Colorectal—malignant
V165—Simultaneous right colectomy and cholecystectomy with ICG immunofluorescence
Teresa Vieira Caroço1, Carlos Eduardo Costa Almeida1, C.E. Costa Almeida1, H. Louro2, S. Graça2, J. Vilaça3
1Hospital da Luz / Universidade de Coimbra, Surgery, 2Centro Hospitalar de Vila Nova de Gaia e Espinho, Surgery, 3Hospital Luz Arrábida, Surgery, Portugal
Introduction: Anastomotic dehiscence, duodenal injury, and ureteral injury are some of the possible complications of the right colectomy. Bile duct injury is the most feared complication of cholecystectomy. New technologies with augmented reality can help to reduce these risks. The authors present a laparoscopic right colectomy plus cholecystectomy, using indocyanine green immunofluorescence (ICG) for identification of the hepatic-cystic junction, vascular evaluation of the anastomosis, and visualization of the ureters.
Methods: A 70-year-old female patient with a neoplastic lesion in the right colon and symptomatic gallstones underwent both laparoscopic right colectomy and cholecystectomy. Cystoscopic ureteral catheterization for ICG injection was performed. The gallbladder was injected with 5 mL of ICG solution before cholecystectomy. The colonic resection site was decided three minutes after intravenous injection of 5 mg of ICG. Anastomosis vascularization was also evaluated with ICG immunofluorescence.
Results: It was easier to identify the main bile duct and the hepatic-cystic junction after the gallbladder injection of ICG. By flowing into the duodenum, the ICG constantly identified the duodenum throughout the colectomy. The visualization of the ureter with the ICG allowed for safer surgery. The intravenous administration of ICG made it possible to safely perform the colic section in the well-vascularized territory. A good vascularization of the anastomosis was confirmed with the ICG immunofluorescence.
Discussion: The authors are convinced of the value of augmented reality to improve intraoperative safety. The low cost of this technology and the absence of toxicity reinforce its interest. This safety strategy will surely be part of the gold standard shortly in colorectal surgery.
Colorectal—malignant
V166—Splenic Flexure Mobilisation, How to do it and how not to do it?
Mahmoud Abdel-dayem1, H. Bakr2, A. Wagstaff2, A. Masoud1
Prince Charles Hospital, 1Colorectal surgery, 2Surgery, United Kingdom
Introduction: Splenic Flexure Mobilisation can be challenging. It can be done either to gain extra length for a tension free anastomosis or as a part of colonic resection. Identifying the right dissection plane and the vital structures around the flexure are the keys for safe mobilisation.
Aim: To demonstrate a streamlined approach to a safe laparoscopic mobilisation of the splenic flexure compared to dissection in the wrong plane.
Method: The patient is positioned with head and left shoulder up.
Duodeno-jejunal flexure mobilisation.
Dissection and control of the Inferior Mesenteric Vein.
Dissection to enter the lesser sac while keeping the stomach in view at the back.
Visualisation of the Pancreas and Perinephric fascia with a swab put as a marker on top of them from the medial aspect.
Division of the gastro-colic omentum followed by lateral dissection till a medially inserted swab is identified from lateral and superior aspects.
The same principles apply to splenic flexure mobilisation to gain extra length however the junction between the descending and sigmoid colon is divided using endo-staplers and dissection of the mesentery continues in a cephalad direction.
Results: We believe that this stepwise approach for splenic flexure mobilisation is safe as long as dissection in the retro-pancreatic plane is avoided.
Conclusion: This stepwise and streamlined approach is helpful to facilitate successful and safe laparoscopic splenic flexure mobilisation.
Colorectal—malignant
V175—Association of personal health profile score and indocyanine green test to prevent adverse outcome and anastomotic leakage in elderly patients
Andrea Costanzi, M. Monteleone, A. Locatelli, G. Colletti, C. Frattaruolo, L. Gallitiello, M. Confalonieri
San Leopoldo Mandic Hospital, ASST Lecco, Merate, Italy, General Surgery, Italy
Aims: Evaluating preoperative frailty is critical for guiding surgical decision-making.
The purpose of this video is to present the association of a preoperative frailty index (Personal Health Profile—PHP) and intraoperative Indocyanine Green (ICG) test and air leak test (ALT) to prevent anastomotic leakage and adverse outcomes following colorectal surgery.
Methods: A 83 years-old woman with no comorbidities was admitted to our department for obstructive sigmoid colon cancer with no liver or nodal metastases. The preoperative assessment included a multidimensional evaluation by the Frailty Department, through the PHP generated by 7 questions and 25 sub-questions including 2 subscales [Changes in Health End-Stage Disease Signs and Symptoms Scale (CHESS) and Pain Scale (PS)], to determine the degree of frailty of the patient. The patient underwent laparoscopic left hemicolectomy with intracorporeal colorectal anastomosis with circular stapler (Ø 29 mm). The integrity of the anastomosis was assessed by ICG test and ALT.
Results: The PHP score, associated to the CHESS scale and the PS, revealed a low risk profile, with a value of 0.27. The highest values were found in the assessment of pain, mood symptoms and weight loss but not in cognitive status, autonomy and mobility, which were preserved. According to the low risk profile we decided to perform colonic resection and anastomosis directly. During laparoscopic surgery, an obstructive sigmoid colon cancer was detected intraoperatively (Histology: adenocarcinoma pT3pN0G2). The integrity of the anastomosis was assessed by ICG test and ALT. ICG showed a good intestinal perfusion before and after the anastomotic creation. The ALT was negative. The patient was admitted to the intensive care unit the first post-operative day (POD). The post-operative course was uneventful, ERAS protocol was respected, and she was discharged on day 6 after surgery.
Conclusions: There is a paucity of research on frailty and surgical approach in elderly oncological patients. Frailty is a valuable tool for preoperative risk stratification and may guide targeted interventions. The association of preoperative PHP and intraoperative ICG test and ALT is a simple, inexpensive, and side effects free method, to avoid adverse outcomes and anastomotic leaks in the elderly.
Colorectal—malignant
V176—Natural orifice surgery can be less controversial in selected cases!
Mahmoud Abdel-dayem1, H Bakr2, A. Wagstaff2, A. Masoud1
Prince Charles Hospital, 1Colorectal surgery, 2Surgery, United Kingdom
Introduction: The main criticism of natural orifice surgery is adding an extra layer of risk to minimally invasive surgery. In selected cases the added risk is minimised when the natural orifice is used as a part of a combined procedure.
Aim: To demonstrate a case of laparoscopic anterior resection of the rectum combined with laparoscopic assisted vaginal hysterectomy. The specimen is delivered, and the bowel is prepared for a trans-vaginal anastomosis.
Method: This was a case of an early upper recto-sigmoid tumour with an endometrial lesion shown in the staging CT scan. The decision of the Colorectal and Gynaecology MDTs was to proceed for a combined approach. The following approach was used:
Medial to lateral mobilisation of the recto-sigmoid mesentery followed by control of the Inferior Mesenteric Artery.
Identification and protection of the left ureter.
Lateral mobilisation of the sigmoid colon and rectum.
The upper rectum and sigmoid-descending junction were divided using endo-stapler and the specimen was secured in an endo-bag.
Full mobilisation of the splenic flexure and division of the IMV at the lower border of the pancreas to ensure tension free anastomosis.
Laparoscopic assisted vaginal Hysterectomy was performed.
Resected bowel and uterus were delivered through the vagina.
The bowel was prepared through the vagina for the anastomosis and returned back into the peritoneal cavity followed by closure of the vaginal vault.
Stapled colorectal anastomosis was performed.
Results: Patient had a smooth postoperative recovery following the Enhanced Recovery Protocol and was discharged on the 3rd postoperative day.
Conclusion: We recommend natural orifice surgery in selected cases as long as the extra-risk is minimised. The procedure is oncologically safe and the anastomosis is tension free.
Colorectal—malignant
V197—Laparoscopic TME preserving the left colic artery for synchronous rectal cancer and complicated sigmoid diverticular disease
Francesca Di Candido, D. Cassini, A.G. Epifani, C. Accardo, M. Ardu, G. Baldazzi
Sesto San Giovanni Hospital, Complex Unit of General, Minimally Invasive and Emergency Surgery, Milan, Italy
Aim: D2 laparoscopic total mesorectal excision (TME) preserving the left colic artery is still a technically challenging procedure performed to avoid the risk of anastomotic leakage.
Methods: we presented the case of a 65 years old man who was diagnosed with rectal cancer (6 cm from the anal verge) an sigmoid pseudotumor for previous complicated diverticulitis. His medical history reported congestive heart disease and hypertension controlled with medical therapy. At pre-operative staging pelvic MRI showed cT2N0 and CT showed no metastatic lesions. The case was discussed in a multidisciplinary team and he was indicated for surgery with laparoscopic approach.
Results: the patient was placed in modified lithotomy position using adjustable stirrups. Pneumoperitoneum was created with the Veress needle technique inserted at Palmer’s point. The 12-mm camera port was placed halfway between the umbilicus and the xiphoid and 2 cm to the right of the umbilicus. A 10-mm trocar was placed when the right spine-umbilical line crossed the mid-clavicular line; a 5-mm trocar was placed on the mid-clavicular line in the left quadrant; a 5-mm trocar is placed along the mid-clavicular line in the left flank. Surgeon stands at the right side of the operating table and the camera assistant at surgeon's right side. We start with a medial to lateral approach, performing dissection as close as possible to the transverse colon.
Once we achieve a complete splenic flexure mobilization, mesenteric vessels sections and total mesorectal excision (TME) were performed. According to the principles of oncological surgery we performed a complete D2 linfadenectomy and left colic artery was preserved. Anastomotic perfusion was checked with indocyanine green fluorescence angiography (ICG-FA). A stapled end-to-end colorectal anastomosis with a diverting ileostomy was finally performed.
Conclusions: the patient was discharged on the 4th post-operative day. No post-operative complications were reported. Tumour stage was classified as pT2N0R0 (0/25 retrieved lymphnodes), therefore no adjuvant therapy was indicated. Ileostomy closure was performed after 2 months with previous check through a barium rectal enema.
Colorectal—malignant
V198—ICG immunofluorescence in a left colectomy
Teresa Vieira Caroço1, H. Louro2, C.E. Costa Almeida3, J. Vilaça4
1Instituto Português de Oncologia de Coimbra, Surgery, 2Centro Hospitalar de Vila Nova de Gaia e Espinho, Surgery, 3Hospital da Luz, Surgery, 4Hospital Luz Arrábida, Surgery, Portugal
Introduction: Colorectal surgery has an overall mortality of up to 3% and a complication rate of 20%. Anastomotic dehiscence (incidence of 3 to 15%) and ureteral injury are possible complications. New technologies allow for surgery with augmented reality in order to decrease morbidity. This video describes a radical left colectomy step-by-step with the use of immunofluorescence with indocyanine green (ICG) for vascular evaluation of the anastomosis and visualization of the ureters.
Methods: A 56 yo female patient was submitted to a radical left colectomy because of a neoplastic lesion located 45 cm from the anus margin. At the beginning of the procedure, a cystoscopic ureteral catheterization for ICG injection was conducted. Three minutes following intravenous injection of 5 mg of ICG the perfect site for colonic resection was decided. Later on, vascularization of anastomosis was also evaluated with ICG immunofluorescence.
Results: The dissection of the mesocolon with ureter identification with ICG allowed for safer surgery and easier dissection of the interfascial space below the inferior mesenteric artery. Intravenous injection of ICG increased surgery safety. ICG made it possible to resect the bowel in a well-vascularized territory. Evaluation of anastomosis vascularization was also possible with the ICG.
Discussion: The authors are convinced of the value of augmented reality to improve intraoperative safety. The low cost of this technology and the absence of toxicity reinforce its interest. This safety strategy will surely be part of the gold standard shortly in colorectal surgery.
Colorectal—malignant
V199—Laparoscopic technique of difficult adhesiolysis in low lying rectal cancer: tips and tricks
Jayesh Gori, Avanish Saklani, V. Sukumar, M. Kazi, A. Mohan, J. Murugan, A. deSouza, A. Saklani
Tata Memorial Hospital, Mumbai, Division of Colorectal Surgery Department of Surgical Oncology, India
Aims: In colorectal cases minimal access surgery has proven benefits in short terms (Early recovery, less blood loss, decreased analgesic requirement) and long terms (oncological and functional) outcomes. Still in some cases it needs to convert into open cases due to adhesions or other causes. In this video we aim to demonstrate technique of difficult adhesiolysis in low lying rectal cancer.
Methods: A 66-year-old lady with k/c/o Diabetic and hypertensive on treatment was diagnosed with locally advanced low rectal cancer with large left obturator nodal mass. She received NACTRT of 50 gy in 25 Fraction with concurrent capecitabine to primary and boost 65 Gy in 25 fractions to the nodal mass. After Interval of 8 weeks, she underwent laparoscopic Extralevator abdominoperineal resection with left pelvic nodal dissection with V–Y plasty for perineal reconstruction.
Results: During the initial part of the surgery only there were dense omental adhesions in pelvis and lower abdominal wall. There were dense adhesive band most likely congenital between the sigmoid colon and distal ileal mesentery and right abdominal wall. In such scenario also we planned to proceed gradually laparoscopically instead of opening. In video we had showing the difficult adhesiolysis and congenital band division – proceeding from one of the edge of adhesions, appropriate use of energy devices, assistant work and good operating team.
Conclusion(s): With Experience, patience and good surgical team even in difficult cases laparoscopically surgery feasible.
Colorectal—malignant
V200—TEMS resection for a low rectal lesion
Vasileios Kalatzis, A. Tsiamis, V. Garimella
University Hospital of North Midlands—Royal Stoke, General Surgery—Colorectal, United Kingdom
Aim: Video case of a TEMS resection, using Vicryl Suture Technique.
Methods: 74 year old male presented via the Bowel Cancer Screening Programme. Colonoscopy revealed a 15 mm Paris2C polyp, type 5 pit pattern in the lower rectum. Non-palpable lesion. Histology: Low and High Grade dysplasia, suspicious of invasion but adenocarcinoma could not be excluded. Pelvic MRI: 16 × 20x25mm lesion, polypoid, 10’ to 3’ o’clock. Lower end 5 cm from anorectal junction. Mostly T2, but early T3a not ruled out,Nx. CT = M0. rTNM:T2N0M0. MDT decision was to offer a TEMS excision, taking in consideration non-conclusive histology and patients co-morbidities. Patient opted for TEMS, which he underwent uncomplicated and discharged day one. Post-operative histology: Moderate differentiated adenocarcinoma pT1(SM3)pNX LV0Pn0R0,tumour budding present.
We present in this video, a technique that we implement during our last cases of TEMS resections. Platform used: Karl-Storz TEO Rigid Proctoscope. We place a Vicryl suture 2/0 and ‘’anchor’’ it peripherally of the lesion.This handling allows us not only to manipulate the lesion in a non-touch technique, reducing thus the risk of contact bleeding and distortion of the specimen but also to achieve a 3d-orientation of the specimen as it is placed in the most medial/luminal part of the lesion. Vicryl suture is then used to achieve easier the tension needed for the resection to be performed. We found that this gives us more flexibility in working in the confined space of the rectum. After the resection, we use Betadine for washout. Defect closed with a self-locking running suture, V-Lock. Creating an ‘’extra loop’’ extracorporeal helped significantly compared to trying to pass the needle from the existing loop. As the lesion was T1-SM3, tumour budding, TME operation was offered. He underwent a Robotic Low Anterior resection, loop Ileostomy. No residual tumour identified,LN harvest was negative (0/20). Final staging: Moderately Differentiated Adenocarcinoma, pT1pN0LV0Pn0,R0.
Conclusion: TEMS resection in selective cases can reduce the morbidity and mortality especially in elderly patients who otherwise would need to undergo a TME operation. Crucial to extract the merits of this procedure is a well-established early rectal cancer service, with experienced Radiology and Pathology department and of course a case load that would allow TEMS resection to be performed safely.
Colorectal—malignant
V201—Laparoscopic total proctocolectomy with ileal pouch-anal anastomosis: a video vignette
Sanket Bankar, V. Sukumar, S. Patel, J. Jitender, A. Desouza, A. Saklani
Tata Memorial Centre, Mumbai, Surgical Oncology, India
Aims and objectives: Laparoscopic total proctocolectomy for rectal cancer with ulcerative colitis has been shown to be technically feasible in experienced hands with acceptable perioperative and oncological outcomes. In this video we describe the steps of laparoscopic total proctocolectomy with ileal pouch–anal anastomosis in a case of carcinoma rectum in the background of ulcerative colitis.
Materials and methods: The procedure was performed under general anaesthesia with patient positioned in a modified lithotomy position. A standard total mesorectal excision (TME) was performed with high ligation of the inferior mesenteric artery and vein. TME was continued just outside the mesorectal fascia to the levator ani muscles, which was exposed circumferentially around the rectum. The entire colon was mobilized with ligation of ileocolic and middle colic pedicles. The surgical specimen was extracted through an incision at the future ileostomy site. A 15-cm J-pouch was prepared and transverse release incisions were made in the mesentery. The pouch was delivered into the pelvis ensuring that there was no twist. The pneumoperitoneum was recreated using a wound protector and a glove. A tension-free stapled anastomosis was performed using a circular stapler no.29. A diversion loop ileostomy was performed.
Results: Patient had an uneventful recovery and discharged on POD 6.
Conclusion: Total proctocolectomy with ileal pouch anal anastomosis is feasible by the laparoscopic approach and has an early post-operative recovery.
Colorectal—malignant
V202—Laparoscopic resection of splenic flexure for stenosing colon cancer
Alessia Fassari, MM Lirici, A Biancucci
San Giovanni Addolorata Hospital Complex, General Surgery, Italy
Aim: laparoscopic resection of the splenic flexure for colon cancer may be a challenging procedure that requires sticking to technical and anatomical principles to be oncological sound.
Materials and Methods: In this video, we present the clinical case of a 63-year woman admitted to our hospital for anemia and increasing obstructive-type symptoms. Colonoscopy and abdominal CT-scan showed a splenic flexure wall thickening with a 6 cm in transversal diameter stenosing mass. Endoscopic biopsy revealed the presence of an infiltrating adenocarcinoma.
Laparoscopic splenic flexure resection was performed starting with a medial-to-lateral mesocolic dissection approach. The inferior mesenteric vein is dissected free right below the inferior margin of the pancreas down to the merging of the left colic vein that is divided between clips. Then, the inferior mesenteric artery is dissected and skeletonized identifying the left colic artery which is isolated and tied up at its origin. The procedure is furthered with the complete take-down of the left colonic flexure, the extraction of the bowel through a mini-laparotomy protecting the wall with an o-ring device and dividing the left branch of the mid colic artery, thus completing the lymph node dissection. The procedure is completed fashioning an extracorporeal isoperistaltic side-to-side mechanical anastomosis and checking the operating field by laparoscopy with suturing of the breach on the mesocolon.
Results: Total operative time was 180 min. Pathological examination showed a poorly cohesive (G3) large bowel adenocarcinoma staged as pT3, pN0 (0 out of 14 harvested nodes). All margins were negative (R0). The postoperative course was uneventful, and patient discharged on postop day 5.
Conclusions: Splenic flexure resection remains a difficult colorectal procedure and needs a stepping learning curve. It implies some technical difficulties, including laparoscopic identification of middle and left colic vessels and subsequent lymph node dissection to reduce local recurrence. In a setting where experienced surgeons are working, this type of laparoscopic resection is feasible and safe for patients both with early-stage or locally advanced splenic flexure cancer.
Colorectal—malignant
V203—Video presentation: laparoscopic excision of appendicular mucocele and caecal pole; a safe alternative to open surgery
Farshid Ejtehadi, V. Vijay
The Princess Alexandra Hospital NHS Trust, Colorectal Department, United Kingdom
Appendicular mucocele is an uncommon pathology of the appendix. It is defined as an aseptic distension of the appendicular lumen with mucous secondary to blockage of the outflow into the caecum due to fibrosis, mucosal hyperplasia, mucinous cystadenoma, or cystadenocarcinoma.
Due to a lack of specific symptoms, pre-operative diagnosis of an appendicular mucocele may be challenging. Radiological investigations may not be able to provide an accurate diagnosis as the findings are similar to features of right adnexal cystic lesion. Although colonoscopy may be normal, it can show extrinsic pressure on the caecal wall,—“volcano sign” is a typical colonoscopy feature which demonstrates the appendicular orifice surrounded by a firm mound covered by normal mucosa.
The gold standard treatment of a benign mucocele is surgical excision. Though a laparoscopic approach is widely used for colonic resections and acute appendicitis,, the safety and efficacy of laparoscopic resection of an appendicular mucocele is controversial and not globally accepted due to the risk of perforation and subsequent pseudomyxoma peritonei.
Pseudomyxoma peritonei is a known complication of ruptured mucocele caused by spillage and implantation of mucin-secreting cells within the peritoneal cavity. Therefore, minimal-manipulation technique should be utilised to minimise the risk of rupture and complication rate of pseudomyxoma peritonei during a laparoscopic procedure. This can be achieved by transecting the base of the caecum by using endoscopic stapling devices and using a laparoscopic bag to safely contain the specimen and minimise the risk of specimen rupture. Care should also be taken to ensure that the ileo-caecal junction is well away from the staple line and is not narrowed or tented during the procedure.
In our video, we present a case of appendicular mucocele with pre-operative radiological and colonoscopy findings and demonstrate a safe performance of excision of appendicular mucocele using a laparoscopic stapler to transect the base of the caecum keeping well away from the ileo-caecal junction. The procedure is performed as a day case and we believe it to be the preferred option to open surgery.
Hepato-biliairy & pancreas—gallbladder
V137—Robot-assisted surgery for gallbladder cancer
Fulthon Frank Vela-Polanco, A. Escartin Arias, J. Jara Quezada, P. Muriel Álvarez, H. Salvador Roses, M. González Daigues, J.J. Olsina Kissler
Hospital Universitari Arnau de Vilanova, HPB Surgery, Spain
Background: Carcinoma of the gallbladder (GBC) is the most common malignancy of the extra-biliary tract, it is usually diagnosed accidentally during or after cholecystectomy. The only potentially curative option for patients is radical resection including lymphadenectomy. However, minimally invasive surgery for GBC has traditionally been discouraged, with limited studies reporting on its outcomes.
Aim and Objectives: The aim of this study is to describe our technique step-by-step for the Robotic-assisted surgical treatment of GBC.
Clinical Case: We present a case of a 75-year-old woman presented to the outpatient clinic follow-up with the suspected diagnosis of GBC. Her medical history include hypertension, hipothyroidism, caesarean section and was notable for a recent sigmoidectomy for colorectal carcinoma in 2018. A routine hematological and biochemical tests were unremarkable including a Ca 19–9 value of 20.6 UI/mL. An abdominal Computed Tomography revealed the presence of a gallbladder lesion was about 33 mm and excluded any distant metastases. A Magnetic Resonance Imaging was performed to confirm the CT findings. The patient underwent to surgery through our DaVinci surgical system, 6 trocars were placed (2 for the laparoscopic assistant). Radical resection was carried-out including the extra-biliary tract. The hospital stay was uneventful and the patient was discharged on the sixth post-operative day. The pathologist reported a GBC of 4,4 cm with only metastasis in the cystic lymph node, there were no malignancy in the liver nor the extra-biliary tract (pT2N1).
Conclusions: Even though endoscopic approach for GBC has long been contraindicated, few recent studies have demonstrated the oncologic outcomes of this treatment. We present a Robot-assisted radical resection for GBC demonstrating its feasibility and safety. Minimally invasive techniques have emerged as a promising way to reduce time for recovery of patients with similar oncological results. The long-term results from comparisons between endoscopic and open procedures are needed to assess the oncologic outcomes of the robotic approach.
Hepato-biliairy & pancreas—gallbladder
V138—Laparoscopic transgastric endoscopic retrograde cholangiopancreatography (ERCP) after gastric bypass surgery
Rutger-Jan Renger1, M. Dekeyser2
Beatrix Hospital Gorinchem, 1Surgery, 2Gastroenterology, The Netherlands
Aim and Introduction: Laparoscopic Roux-en-Y gastric bypass is the most performed procedure for obesity. Due to the weight loss, these patients have an increased risk of developing gallstones in the gallbladder as well as in the common bile duct.
The postoperative anatomy excludes the biliary tree from traditional evaluation and treatment with endoscopic retrograde cholangiopancreatography (ERCP).
We demonstrate a minimally invasive technique to access the bypassed stomach after Roux-en-Y gastric bypass for endoscopic diagnosis and treatment.
Methods and Results: After introduction of pneumoperitoneum, a total of four ports were placed. We first performed a laparoscopic cholecystectomy. Then a purse-string was placed around a gastrotomy 4 to 6 cm proximal to the pylorus. The endoscope was introduced through the 15 mm left-upper-quadrant port and the gastrotomy. An ERCP was performed and finally the gastrotomy was closed with a linear stapler.
Conclusion: Laparoscopic assisted transgastric ERCP is feasible. With the growing incidence we state that the procedure can be performed in hospitals with endoscopic expertise and not only exclusively in bariatric centers.
Hepato-biliairy & pancreas—gallbladder
V139—Laparoscopic cholechystectomy for Mirizzi syndrome in severe obese patient: challenging but feasible
Andrea Biancucci, Alessia Fassari, A. Fassari, M.M. Lirici
San Giovanni Addolorata Hospital Complex, Department of Oncologic Surgery, Italy
Aims: Mirizzi syndrome (MS) is an uncommon cause of extrahepatic biliary duct compression resulting from longstanding gallstone disease and remains a surgical challenge. The video features a noteworthy case of type I MS in morbid obese patient who were diagnosed correctly preoperatively and successfully treated by laparoscopic approach.
Methods: 47-year-old male patient with 53 kg/m2 BMI was admitted for an elective laparoscopic cholecystectomy due to a chronic calculous cholecystitis, persistent abdominal pain and mild jaundice. Magnetic Resonance revealed an hydropic gallbladder and a type I MS.
Fundus first cholecystectomy was performed with a difficult detachment of the infundibulum from the right and common hepatic duct. In spite of anatomical difficulties, appropriate and careful dissection of the gallbladder infundibulum and neck, impacted by gallstone, allowed to identify first the cystic artery, then a short cystic duct which were clipped and divided safely.
Results: Operating time was 110 min. Postoperative course was uneventful and the patient was discharged on postoperative day 2.
Conclusion: Laparoscopic management of Mirizzi syndrome is feasible and safe but in obese patients is challenging and high skill demanding. Experienced laparoscopic surgeons and extensive knowledge of anatomical landmarks are required to treat such patients through a minimal invasive approach.
Hepato-biliairy & pancreas—gallbladder
V140—Impacted, large and multiple choledochal stones: laparoscopic choledochotomy and choledochoscopy exploration
Jinghuang Ye Zhou, C. Galan, M. Rodriguez, B. Martin, V. Molina, A. Moral, S. Sanchez Cabús
Hospital de la Santa Creu i Sant Pau, Cirugia General y Digestiva, Spain
Aims: To show a minimally invasive surgical approach of large and multiple impacted choledocholithiasis.
Methods: We present a video of a laparoscopic cholecystectomy and common bile duct exploration in a 90-year-old female with acute cholangitis symptoms.
Results: Choledochotomy with primary suture was performed after extraction of large and multiple impacted choledocholithiasis and intraoperative flexible choledochoscopy was employed to confirm common bile duct stone clearance.
Conclusions: The management strategy for complex choledochal stones in patients over 75 years is a real challenge that requires balancing the efficacy of a multiplicity of procedures against their own morbidity. When endoscopic retrograde cholangiopancreatography (ERCP) failure is anticipated and/or the risk of post-ERCP complications is high, surgery should be considered as the first-line treatment. Laparoscopic common bile duct exploration is a cost effective, efficient and minimally invasive approach that can be carried out safely with acceptable morbidity and mortality even in difficult situations, but patients should be adequately selected.
Hepato-biliairy & pancreas—gallbladder
V141—Laparoscopic cholecystectomy in the left lateral decubitus position
Pedro Antonio Montalbán Valverde, J.E. Sanchez Lara, R. Rodrígez García, T. Rubio Sánchez, E.A. Diego Alonso, S. Garrosa Muñoz, J.M. Nieto Arranz, J. Lopez Sanchez, S. Alonso Batanero1, B .Barón Salvador, A.M. Rodríguez Rivas, C. González Sanchez, G. Franch Arcas, L. Muñoz Bellvis
Hospital Universitario de Salamanca, Cirugía General y del Aparato Digestivo, 1Hospital El Bierzo de Ponferrada, Cirugía General y del Aparato Digestivo, Spain
Introduction: In 1987, French surgeon Philippe Mouret performed the first laparoscopic cholecystectomy. Since then, there have been many variations and improvements in this technique.
Currently, it has become one of the most frequent laparoscopic surgeries around the world. The most common being its performance in "French" or "American" positions, depending on the position of the surgeon and the number of trocars employees.
Clinical case: We present the case of a 68-year-old woman with a personal history of hypertension and hysterectomy due to myomatosis.
The patient was studied for symptomatic cholelithiasis, when she was diagnosed with a 73-mm right adrenal incidentaloma. The radiological appearance was suggestive of myelolipoma and the hormonal study was negative.
Given the findings, we proposed surgical treatment of both pathologies for resolution in the same surgical act.
Conclusion: In this video we show a laparoscopic cholecystectomy taking advantage of the position in which the patient had been previously placed to perform the right adrenalectomy.
This technique does not pretend to be the usual technique, however it can be a good resource that allows, in these situations, to reduce the surgical time to reposition the patient, and it also reduces the number of trocar incisions, with the associated morbidity.
All this allows us to perform laparoscopic cholecystectomy respecting the ¨critical view of safety¨. With the difference in this case, due to the anatomical disposition, the liver dissection of the gallbladder is performed first and it is released to perform a safe section of the cystic artery and duct.
Hepato-biliairy & pancreas—gallbladder
V142—Gallbladder agenesis with dysmorphic cyst: a diagnostic laparoscopic challenge
Main author: Massimiliano Cinalli
Massimiliano Cinalli1, S. Di Russo1, P. Panaccio1, V. Casolino1, F. Mucilli2, R. Cotellese3, F. Selvaggi1
1Unit of General Surgery, "Renzetti" Hospital, Lanciano, Chieti, Italy, Department of Medical, Oral and Biotechnological Sciences, "G. d'Annunzio" University, 2General and Thoracic Surgery "SS.Annunziata" Hospitali, Chieti, Department of Medical, Oral and Biotechnological Sciences, "G. d'Annunzio" University, 3Fondazione Villa Serena per la Ricerca, Department of Medical, Oral and Biotechnological Sciences, "G. d'Annunzio" University, Chieti-Pescara, Italy
Aims: To examine the experience of a patient with gallbladder agenesis and acute cholecystitis like-symptoms, incidentally diagnosed during laparoscopic cholecystectomy.
Methods: We retrospectively evaluated our first case of surgically confirmed gallbladder agenesis after 753 consecutive cholecystectomies performed from September 2016 to March 2021 in the Surgical Unit of “Renzetti” Hospital in Lanciano, Italy.
Results: The incidence of gallbladder agenesis was around 0.13% in our series. A fragile 84-year-old patient presented dyspepsia and vomiting with acute pain in the right upper quadrant of the abdomen. Ultrasound imaging supported the diagnosis of acute calculous cholecystitis with chronic inflammation, atrophy and sclerosis. Laboratory tests showed acute inflammation with increased white blood cell count (15,43 × 10^3/uL) and total serum bilirubin level of 1,81 mg/dL. The indexes of cholestasis and serum tumor markers (CEA, CA 19–9, α-FP) were normal. During laparoscopy, we found a proximal transverse colonic angle strictly adherent to the gallbladder fossa. None well-formed gallbladder with classic pear shape was observed. After mobilization of the colon, we observed the presence of a small dysmorphic cyst of 2 × 2 cm, along the bed of the gallbladder. The surgical procedure was concluded after lysis of colonic-hepatic adhesions and repair of small areas of colonic peritoneal lacerations with absorbable sutures. The post-operative period was uneventful. The CT (computed tomography) scan of the abdomen and the magnetic resonance cholangiopancreatography (MRCP) eventually confirmed the diagnosis of lithiasic gallbladder agenesis. The patient was discharged in good clinical conditions and scheduled in an observational radiological program.
Conclusions: Gallbladder agenesis is a rare embryological anomaly, often asymptomatic, but frequently mimicking acute cholecystitis syndrome. Especially during the last decade, gallbladder agenesis is commonly diagnosed after minimally invasive surgery. Surgeons have to be familiar with this rare entity and any conversion in laparotomy or unplanned surgical strategies should be indicated in the same operative setting.
Hepato-biliairy & pancreas—gallbladder
V144—Kehr-related complication in biliary surgery. Laparoscopic Kehr removal
Francisco J. Buils Vilalta, J.J. Sánchez Cano, C. Morales Tugues, M. Vives Espelta, E. Homs, E. Bartra, P. Martínez, M.A. García, A. Sánchez Marín
Sant Joan Hospital, General and Digestive Surgery, Spain
Introduction: The Kehr “T” tube is an instrument that has been used for more than a century as a biliary drain after surgery on the main bile duct. Many surgeons consider it an essential tool after performing a supraduodenal choledochotomy, although others associate its use with a high rate of complications.
Material and Method: A 44-year-old female patient with a history of symptomatic cholelithiasis admitted due to acute cholangitis. The CT + ColagioMR shows the presence of multiple cholelithiasis associated with single obstructive choledocholithiasis with secondary dilatation of the intra + extrahepatic bile duct. ERCP is performed with sphincterotomy, papiloplasty with partial removal of stones with placement of a plastic biliary prosthesis. A month later, a new ERCP was performed with prosthesis extraction, completing the cleaning of the bile duct. Subsequently, a laparoscopic cholecystectomy is scheduled, observing in the surgical act new occupation of the bile duct due to stones, proceeding to complete the surgery with exploration of the bile duct with stone extraction and Kehr placement via laparotomy. The patient was discharged on the 9th postoperative day after performing a transKehr cholangio without identifying images of choledocholithiasis.
Results: After the impossibility of removal of the Kehr and after control by means of new imaging tests (Tc + ColangiotransKehr), a laparoscopic surgical exploration was decided, finding fibrosis around the Kehr path, achieving its extraction with the placement of a new drain that it was later withdrawn without any problems or complications.
Conclusion: Most complications are related to the moment of extraction and almost all of them involve the leakage of some amount of bile. In our case, the complication consisted of the impossibility of extraction, needing surgical exploration through a laparoscopic approach to resolve the problem.
Hepato-biliairy & pancreas—gallbladder
V145—Fundus lift technique for difficult laparoscopic cholecystectomy in morbidly obese patient
Samer Zino
Ninewells, general surgery, United Kingdom
Laparoscopic cholecystectomy in morbidly obese patient is challenging procedure, not only due to heavy abdominal wall and fatty omentum. Heavy fatty liver that prevents proper retraction of Gall bladder (GB) to allow safe visualisation of hepatocystic trainagle is the main reason to abandon the procedure or perform subtotal cholecystectomy.
Aims: this study describe a new technique that enable satisfactory retraction of the gallbladder fundus avoiding the heavy fatty liver to enhance exposure of heato-cystic triangle that facilitate safe dissection and demonstration of critical view of safety.
Methods: prospectively collected data for patients whom fundus lift technique was necessary to complete their laparoscopic cholecystectomy and IOC + /_ Common bile duct exsploration between 9th of July 2020 and 15th of April 2021.
Results: This video Presents a technique that helps in achieving adequate and safe retraction of inflamed or normal gallbladder over a heavy-fatty liver, hence improveing visualisation of hepatocystic triangle. Fundus Lift technique aims to free the fundus of the gallbladder from the liver bed through the submucosal plane for 2-4 cm. The techniques starts with cutting the serosa of the gallbladder fundus 3-5 mm away from the liver, starting form 2 O’clock to 10 o’clock. Then the cut is deepened till reaching the submucosal plane that allow safe and bloodless dissection of the fundus of the cystic plate. Hydro dissection could be useful to expand the potential plane and demonstrate the tissue fibres more easily. Fundus is dissected of liver bed for 2–4 cm. Freeing the fundus will allow lifting it along with the gallbladder over the heavy liver-edge to achieve adequate retraction of the GB toward the right shoulder avoiding heavy fatty liver resistance and iatrogenic damage to the liver that could result from pushing the GB into liver tissue.
Funds lift will help in bringing the hepatocystic triangle into view and facilitate safe dissection toward achieving Critical view of safety.
6 cases out of 101 laparoscopic cholecystectomy needed fundus lift to perform safe complete cholecystectomy and Intra operative cholangiogram. Three patient(50%) needed Trans cystic CBD exploration. Mean age was 57y (36- 76) 4 patient were females. 5 out of 6 were emergency admissions. Mean BMI was 45 ( 38–50).there was no post operative complication or readmission.
Conclusions: this study describe a new and safe technique to enable satisfactory retraction of gallbladder over heavy liver in morbidly obese patients, even in acute situations.
Hepato-biliairy & pancreas—gallbladder
V167—Laparoscopic common bile duct exploration guided by intragallbladder injection of indocyanine green
Roser Termes-Serra1, C. Ginestà2, V. Holguín1, A. Torroella1, R García2, C. Fondevila2
Hospital Clínic de Barcelona, 1General and Digestive Surgery, 2Hepatobiliary and Pancreatic Surgery, Spain
Introduction: Laparoscopic common bile duct (CBD) exploration plus laparoscopic cholecystectomy in the treatment of choledocholithiasis has gained acceptance during the past few years. The transcystic and transductal exploration requires a major dissection of the bile duct with an increased potential iatrogenic injury. Gallbladder injection of indocyanine green (ICG) to perform a real-time fluorescence cholangiography allows a correct identification of the biliary anatomy that may facilitate the procedure.
The aim of this video is to show a case of cholelithiasis with choledocholithiasis treated with single-stage laparoscopic cholecystectomy with transcholedocal approach CBD exploration.
Methods: A 65-year-old woman with medical history of high blood pressure, type 2 diabetes, and recurrent biliary colic presented to the Emergency Department with right upper quadrant pain and jaundice. Blood test showed a cholestasis pattern with a total bilirubin level of 5.3 mg/dL and a direct bilirubin of 3.2 mg/dL. Abdominal ultrasound revealed a lithiasic gallbladder along with an intrahepatic and extrahepatic bile duct dilation. Afterwards a magnetic resonance cholangiopancreatography confirmed the presence of multiple choledocholithiasis with a dilated CBD of 10 mm.
A laparoscopic gallbladder injection of 4 cc indocyanine green was performed, improving the visualization of the cystic duct (CD) and the CBD, which facilitated their dissection. Once biliary anatomy was identified, a laparoscopic ultrasound confirmed the existence of several choledocholithiasis. A choledochotomy was performed allowing the lithiasis extraction with Fogarty catheter and Dormia basket. 5/0 V-Loc was used to close the choledochotomy. After CBD exploration, the procedure was completed with a cholecystectomy.
Results: The surgery was completed without incidences, with total surgical time of 140 min. A complete clearance was achieved. Postoperative evolution was uneventful, with oral intake on the first postoperative day and hospital discharge on the second day. Outpatient postoperative control at the first week and three months after showed no cholestasis on the blood tests.
Conclusions: Intragallbladder injection of ICG achieves an outstanding fluorescence of the biliary structures with an excellent contrast with the hepatic parenchyma and may be a useful tool when a CBD exploration is needed.
Hepato-biliairy & pancreas—gallbladder
V171—Identification of biliary anatomic variations using indocyanine green fluorescence (ICG-FGS) in laparoscopic cholecystectomy
Ariel de Jesús Martínez Oñate
Private Practice, Surgery, Mexico
In this video two cases of different types of anatomic variations are shown. They´re found during what could be considered everyday scheduled cholecystectomies. One case is a rare variation called aberrant cysticohepatic duct and the second case is an accessory hepatic duct coming from segment V of the liver. In both cases the usefulness of ICG-FGS is demonstrated to prevent serious postoperative complications without the need to use X-Ray intraoperative cholangiogram (IOC) or intraoperative ultrasound. Choi´s classification of Biliary Ducts anatomic variations is presented as well. Both patients had normal postoperative courses.
Hepato-biliairy & pancreas—gallbladder
V205—Safe laparoscopic cholecystectomy: seeing the bigger picture complements definition of the critical view of safety
Pradeep Patil
Ninewells hospital and medical school, UpperGI surgery, United Kingdom
The concept of the critical view of safety introduced by Steven Strasberg has been one of the pillars of safe cholecystectomy for more than 15 years. The concept has one major draw back in that it does not enable the surgeon to distinguish or discriminate if the initial dissection is happening to the right of the bile duct or the entire bile duct is being dissected and the dissection is happening on the left side of the bile duct (hepatoduodenal ligament). This is possible if the bile duct is narrow and not inflamed in very simple cholecystectomies or in the difficult cholecystitis where the gallbladder is adherent to the common hepatic duct.
We have developed the concept of the “Bigger picture visualisation” which eliminates or minimises this error.
The following video demonstrates our steps in visualisation of the anatomy describing the Bigger picture before embarking on the dissection of a cholecystectomy.
The main steps include straightening of the hepatoduodenal ligament and identification of the line of the bile duct from the duodenum to the porta hepatis. Both the Porta hepatis and duodenum should be clearly defined. Any tubular structure going towards the porta hepatis is the common hepatic duct unless proven otherwise and any tubular structure going towards the duodenum is the common bile duct unless proven otherwise.
The above view is now extended to the left to clearly define the left edge of the hepatoduodenal ligament where the caudate lobe can be seen beneath the pars flacida. This view clearly establishes the boundaries of the hepatoduodenal ligament and eliminates the risk of dissection of the whole ligament and extreme vasculobiliary injuries.
The bigger picture also includes identifying Rouviere’s sulcus and if possible ( in most patients), visualising the portal vein as the posterior edge of the hepatoduodenal ligament and the sulcus between the portal vein and inferior vena cava. This enables decisions regarding planes of safe dissection and controlled force during dissection due to the knowledge of the proximity of these visualised major structures.
This Bigger Picture helps in defining the anatomy before starting the dissection of the cholecysto-hepatic triangle and proceed to create the critical view of safety of Strasberg – safely. During difficult periods of the operation, there should be a time out and reorientation of the entire team with the bigger picture before considering further steps.
Hepato-biliairy & pancreas—gallbladder
V206—Laparoscopic choledocoduodenostomy. A feasible option even in multioperated patients
Carlos Guillermo Muhlenberg, A Centeno Álvarez, Ruth, Daniel Rolando, Camilo Andrés, Joan, Sergio
Consorci Sanitari Integral—Hospital General de l'Hospitalet, General Surgery, Spain
Aims: This video aims to illustrate a feasible minimally invasive treatment for choledocolitiasis, even in patients in which the biliary tree has already undergone surgery.
Methods: We present the case of a multi-pathological 70-year-old man with previous history of both cholecystectomy and choledocotomy during the same laparoscopic time, and open gastrectomy, that presents again with cholangitis due to a choledocolitiasis. Laparoscopic approach in cases like this is challenging but was the best option for a patient like this.
Results: This video shows how to approach the biliary tree after previous surgery, and a minimally invasive solution for a fragile patient with choledocolitiasis and impossible endoscopic treatment: a laparoscopic choledoco-duodenostomy.
Conclusion: Laparoscopic treatment of choledocolitiasis is feasible even in patients who have already undergone biliar surgery. Minimally invasive approaches such as the one shown are challenging and require patience and expertise, but the benefits outweigh open surgery.
Hepato-biliairy & pancreas—gallbladder
V207—Critical view of safety is valuable in preventing iatrogenic injury to major aberrant arteries during laparoscopic cholecystectomy
Dinesh Singhal, Nitin Vashistha
Max Super Speciality Hospital, Saket, Department of Surgical Gastroenterology, India
Background: Critical view of safety (CVS) is one of the most followed dissection techniques for prevention of bile duct injury (BDI) during laparoscopic cholecystectomy (LC). Although present in up to 50% of patients, utilization of CVS for prevention for major arterial anomalies during LC has seldom been described. We present a short LC video wherein CVS was useful in prevention of injury to an aberrantly coursing right hepatic artery (RHA).
Brief description: A patient in his seventh decade with symptomatic gallstone disease presented for elective LC. After initial dissection three tubular structures, 2 arteries and cystic duct were identified in the Calot’s triangle. One of the arteries was posteriorly coursing, of large calibre in close relation to the cystic duct and neck of gallbladder (Fig. 1). We hypothesized that it was unlikely to be the posterior branch of cystic artery and proceeded to dissect this artery to its termination. The lower one third of the gallbladder body was mobilized off the artery which further coursed anterior to the cystic plate into the liver bed. The use harmonic scalpel was particularly helpful in safe dissection and preservation of vessel. With the anterior and posterior cystic arteries originating from it, this artery was probably the RHA with aberrant extrahepatic course and termination into the gallbladder bed (Fig. 2). With this vessel fully dissected ‘classical’ critical view of safety obtained, the surgery was completed by clipping the cystic artery & duct and dissecting the remaining gallbladder off the cystic plate.
Conclusion: Originally described as a dissection technique for prevention of BDI, CVS is also valuable in preventing iatrogenic injury to major aberrant arteries during LC.
Posteriorly coursing artery in the Calot’s triangle may not always be the posterior branch of cystic artery. Such vessels, particularly when of large calibre need to be preserved and carefully dissected to their termination.

Hepato-biliairy & pancreas—gallbladder
V208—One-stage cholelithiasis and choledocholithiasis treatment, under ultrasound control
Sergio Gonzalez Martinez, D. Coronado, C. Lopez, R. Ribas, C.G. Muhlenberg, J. Sala
H. Moises Broggi. CSI, Surgery, Spain
Introduction: Laparoscopic surgical resolution of cholelithiasis with associated choledocholithiasis (Single-Stage approach) has proven to be reproducible and safe, with similary results to the two-stage procedure; performing endoscopic retrograde cholangio-pancreatography (ERCP) plus posterior cholecystectomy.
The Intraoperative Cholangiography, Choledochoscope and Laparoscopic Ultrasound are tools that help to carry out the procedure successfully.
Clinical Case: We present a clinical case of a 32 years old woman in the first trimester of pregnancy.
No comorbidities.
Went to the emergency room presenting persistent hepatic colic and obstructive jaundice.
Abdominal ultrasound: Gallbladder: Multiple cholelithiasis. 10 mm Bile Duct dilation.
No Magnetic Cholangioresonance was performed.
Diagnostic Orientation: Complicated cholelithiasis with associated choledocholithiasis.
A Single-Stage approach for the management of the case was indicated.
Results: We present a video showing a choledocholithiasis treatment by laparoscopic Single-Stage trans cystic approach.
We use laparoscopic ultrasound as a method to assess the bile duct and assist in the stone removal.
Stages:
Calot dissection and cystic artery section. Cystic duct opening
Calculi visualization by laparoscopic ultrasound
Extraction of two calculi with the Dormia basket under echographic control
Irrigation of the bile duct checking the absence of residual choledocholithiasis
Cystic duct closure and cholecystectomy
Uneventful postop.
Discussion: One-Stage approach for the management of choledocholithiasis with concomitant cholelithiasis is well established.
In cases of transcystic approach, to perform an intraoperative cholangiography is frequently used. On the other hand, the use of conventional radiology was formally contraindicated in pregnancy without an especial protection of the hypogastric area of the patient.
The sensitivity and specificity of ultrasound and cholangiography for the diagnosis of choledocholithiasis are similar; therefore, it would be advisable to use ultrasound in the exploration of the bile duct, whenever possible.
Conclusion:
Laparoscopic ultrasound allows precise visualization of the extrahepatic bile duct
It should be considered as a valuable tool in the diagnosis and surgical treatment of choledocholithiasis
Hepato-biliairy & pancreas—gallbladder
V209—Application of Indocyanine Green Fluorescence Guided Surgery (ICG-FGS) in Laparoscopic cholecystectomy for acute cholecystitis
Ariel de Jesús Martínez Oñate
Private Practice, Surgery, Mexico
Aim: To demonstrate the usefulness of ICG-FGS in difficult cases of laparoscopic cholecystectomy for acute cholecystitis (AC). The 5 cases that are shown in short clips represent what is becoming common in the presentation of AC in my country due to the trouble of having access to surgical care in the public health sector because of the Covid pandemic.
Methods: Video clips of 5 cases of different degrees of AC, according to 2007 Tokyo guidelines. Emphasis is put on the dissection of the Triangle of Calot and identification of cystic duct (CD) and common bile duct (CBD).
Results: In the 5 different cases an early identification of the CBD initially was obtained, and after FGS guidance the dissection of the angle of the CD-CBD, and CD was possible with the aid of FGS. In one particular case of a severe AC, FGS helped to perform the critical view of safety (CVS) with confidence. No bile duct injuries (BDI) were caused and the 5 patients had a good postoperative outcome according to the degree of AC that they presented. Neither X-Ray intraoperative cholangiogram (IOC) nor intraoperative lap ultrasound was needed to identify the biliary ducts. This saved an important but difficult to determine amount of operative time. In spite of difficult anatomic conditions no patient was converted to open procedure.
Conclusion: Although the precise roll of ICG-FGS in the prevention of BDI is yet to be established, in these videos the usefulness of FGS in difficult laparoscopic cholecystectomies for AC is demonstrated. It is clear that ICG-FGS does not substitute the CVS and it helps to perform it in hostile conditions of laparoscopic cholecystectomy. Some features of fluorescence in AC are described, like what I call " excluded gallbladder". A comment on II window NIR is made as it may have promising results in obese patients and in conditions of perivesicular adhesions and inflammation.
Hepato-biliairy & pancreas—liver
V098—Advantages of laparoscopic liver bi-segmentectomy II–III in pluripathological patients with cirrhosis
Alejandro David Bueno Cañones, E. Asensio-Díaz, M. Bailón-Cuadrado, E. Choolani-Bhojwani, F. Acebes-García, P. Marcos-Santos, S. Veleda-Belanche, P. Pinto-Fuentes, F. Labarga-Rodríguez, B. Pérez-Saborido, F.J. Tejero-Pintor, D. Pacheco-Sánchez
Hospital Universitario del Río Hortega, Cirugía General y del Aparato Digestivo, Spain
Objectives: This study was designed to present a video of laparoscopic liver bi-segmentectomy II-III in pluripathological patients with cirrhosis.
Methods: A 67-year-old man with a medical history of hypertension, type 2 diabetes mellitus, dyslipidemia, chronic alcoholism and grade 3BA3 chronic kidney disease. Bilateral total hip arthroplasty was performed in 2010, and a laparoscopic radical prostatectomy, due to a prostate adenocarcinoma in 2019. After presenting elevated liver transaminases, abdominal ultrasound and magnetic resonance were performed, showing a solid 2 × 2 cm lesion in liver segment III. Biopsy of this lesion was compatible with hepatocarcinoma. Bisegmentectomy II-III was proposed in multidisciplinary session, which the patient accepted with prior informed consent.
Results: The procedure was carried out entirely with laparoscopic approach, beginning the surgery with the performance of the Pringle maneuver. Subsequently, bisegmentectomy II-III was carried out after dissecting the portal pedicle of both segments and the left suprahepatic vein. The surgical time was a total of 180 min. There were no intra- or postoperative complications and he was discharged after 48 h.
Conclusion: Laparoscopic liver resection is a complex but feasible and safe technique with oncological results comparable to open procedure. It provides important postoperative advantages for the patient reducing hospital stay, the need for analgesia and surgical stress. This makes possible to reduce the risk of decompensation of liver function, what would imply a worsening of the postoperative period and increases the morbidity of the intervention.
Hepato-biliairy & pancreas—liver
V099—Clinical application of indocyanine green (ICG) fluorescence imaging to detect metastatic peritoneal nodules
Boram Lee, J.Y. Cho, H.S. Han, H.W. Lee
Seoul National University Bundang Hospital, Department of Surgery, Korea
Introduction: A recent study reported that resection of extrahepatic metastasis of hepatocellular carcinoma (HCC) in selected patients improving long-term survival [1]. According to the improved preoperative imaging, sub-centimeter sized metastatic nodules are frequently detected [2], however, it is not easy to localize small extrahepatic nodules during surgery. The usefulness of intraoperative indocyanine green (ICG) fluorescence image for the HCC has been reported [3], while the study for detecting extrahepatic metastasis of HCC is rare.
In this report, we describe a case of HCC metastasizing to the peritoneum, which was detected by ICG.
Case: A 50-year-old man was referred to our department for resection for suspected tumor implants from HCC. Three years before admission, he had undergone several times of transarterial embolization and radiofrequency ablation in segment 6, 8 and 2 (Child–Pugh A, Model for end-stage liver disease score, 10) Follow-up computed tomography revealed multiple perihepatic nodules. To confirm the pathology, we decided to proceed the diagnostic laparoscopy. ICG was intravenously injected at a dose of 0.025 mg/kg, 1 h preoperatively. When we performed the diagnostic laparoscopy under 3-dimentional scope (ENDOEYE FLEX 3D, OLYMPUS, USA), it was failed to detect perihepatic nodules. Then, we applied ICG fluorescent image system (ITS Model-L, InTheSmart Co. Ltd, Korea) ICG mode revealed the clear demarcation of nodule. The tumor was resected using ultrasonic shears. The tumor was histologically confirmed as a metastatic HCC with focal sacromatoid feature.
Conclusion: ICG image can apply for the detection and efficiently resection of metastatic peritoneal tumors during laparoscopic surgery.
Hepato-biliairy & pancreas—liver
V100—Laparoscopic left hepatectomy with extrahepatic glissonean left pedicle isolation
Pablo Marcos-Santos, E. Choolani-Bhojwani, F. Acebes-García, A.D. Bueno-Cañones, S. Veleda-Belanche, M.P. Pinto-Fuentes, F.J. Tejero-Pintor, M. Bailón-Cuadrado, D. Pacheco-Sánchez
Hospital Universitario del Río Hortega, Servicio de Cirugía General y del aparato Digestivo, Spain
Aims: Anatomic resection with extra-glissonian approach reduces the pedicle control time and might expedite the transection of the liver. Laparoscopic liver surgery is currently spreading and has become a technically practicable treatment for liver disease. Herein in this case, we present a left laparoscopic liver resection with extrahepatic isolation of the left hepatic pedicle.
Methods: 62-year-old man with personal history of a laparoscopic left lateral hepatic segmentectomy due to intrahepatic cholangiocarcinoma located in segment II-III. During follow up, an abdominal CT scan detected a tumor recurrence of approximately 2 cm adjacent to the surgical sutures. Surgical treatment was proposed with laparoscopic resection of liver segment 4 to complete left hepatectomy.
Results: Adhesiolysis of the omentum to the liver surface and a Pringle maneuver were performed. Left liver pedicle was approached with extraglissonian dissection between the space of Glisson's fascia and Laennec's capsule, approached through gate 3 to 1, with subsequent transection with vascular staplers after checking the Cantlie line. Section of liver parenchyma was initiated along Cantlie's line. Dissection of the middle hepatic vein from was completed from proximal to distal with branch ligation to segment 4 and section of the distal branch with stapler. Hepatectomy was completed from the middle hepatic vein to the Cantlie line cut surface. Cholecystectomy and extraction of pieces were made by a Pfannenstiel incision. Patient was discharged home on the 4th postoperative day. Pathology exam revealed the presence of a 3.2 cm cholangiocarcinoma.
Conclusion(s): Glissonean pedicle can be isolated using a gap between the Glissonean pedicle and Laennec’s capsule without parenchymal destruction systematically. Left Glissonean pedicle isolation should start identifying Gate I by detaching the Arantius plate from Laennec’s capsule to identify Gate I and followed by detaching the umbilical plate from Laennec’s capsule covering the umbilical fossa at Gate II. By connecting these two gates, the common trunk of the Glissonean pedicles of segment 2 and 3 could be isolated. The Glissonean pedicle of segment 4 could be isolated connecting Gate II and III or Gate III and I in the same manner.
Hepato-biliairy & pancreas—liver
V101—Laparoscopic liver abscess drainage in a morbidly obese patient
Anna Rzepa, J. Rymarowicz, W. Rogula1, T. Wikar, M. Pisarska, M. Pędziwiatr
Jagiellonian University Medical College, 2nd Department of General Surgery, 1Department of Paediatrc Surgery, Poland
An image-guided percutaneous drainage is currently the method of choice in treatment of liver abscesses. It is undoubtedly a safe procedure with a high success rate. However, there may be instances, where it is unfeasible, especially if the abscess is located in the posterior liver segments. In those cases, a laparoscopic drainage can be a good alternative to open surgery.
We present a case of a laparoscopic liver abscess (segment 7) drainage with cholecystectomy in a morbidly obese patient (BMI = 60). The postoperative stay was complicated by rhabdomyolysis with secondary acute kidney injury treated with fluid resuscitation. The patient made good recovery. The video presents a technique of laparoscopic abscess drainage, including superior and inferior liver mobilisation and laparoscopic ultrasound guided abscess incision and drain insertion.
Hepato-biliairy & pancreas—liver
V102—Laparoscopic segment VII resection for hepatocellular carcinoma guided by 3D
Maria Gallego Gotor, V. Molina, M. V. Ortiz, S. González Abós, B. Martin Arnau, M. Rodriguez Blanco, S. Sánchez Cabús
Hospital de Sant Pau i la Santa Creu, Cirugía General y del Aparato Digestivo, Spain
Purpose: Laparoscopic segment VII hepatic resection remains one of the most difficult surgical techniques due to poor accessibility to the tumour and the difficulty of obtaining tumour-free resection margins.
Laparoscopic approach in cirrhotic patients should be well planned, in order to preserve the largest possible liver remnant and assure favourable oncological results. We report a 3D-guided resection of segment VII.
Methods: A 77-year-old woman, ASA 3, with CHILD-A cirrhosis, a suprahepatic pressure gradient of 8 mmHg and thrombocytopenia of 133 × 10 ^ 9 / L, was diagnosed by CT-scan of a 38 mm hepatocellular carcinoma (HCC) located in segment VII. A 3D-guided laparoscopic atypical resection of segment VII was performed.
Results: Operative time was 150 min, with an estimated blood loss of 100 mL and a total Pringle manoeuvre of 26 min. Postoperative course was uneventful. The patient was discharged on the fourth postoperative day, and the drainage could be removed prior to discharge. The pathological analysis confirmed the diagnosis of hepatocellular carcinoma with negative resection margins (> 10 mm in all axes).
Conclusions: Implementation of 3D technology in order to plan hepatic resection allows the reduction of surgical time and decreases intraoperative bleeding, while oncological outcomes are preserved. 3D-guided laparoscopic approach should be a tool to be considered in patients with major comorbidities and high surgical-risk, to minimize surgical complications.
Hepato-biliairy & pancreas—liver
V103—Easy Pringle: a new technical way
Francisco Marrana, R .Peixoto, L. Barbosa, C. Quintela, J.P. Gonçalves, P. Valente, G. Faria
Unidade Local de Saúde de Matosinhos, General Surgery, Portugal
Pringle maneuver was firstly described in 1908 by James Hogarth Pringle as a way of controlling liver hemorrhage after trauma by clamping the hepatic pedicle. With ceasing the hepatic blood inflow via hepatic artery and portal vein, Pringle was able to isolate and determine the source of bleeding and better evaluate the extension of the traumatic injury. Since his first description, this technique has been working as, in his own words, “an assistant” to worldwide surgeons, being afterwards transposed to elective surgery, playing a role also in hepatic resections nowadays.
The classic technique describes the clamping of the hepatic pedicle by entering the omental bursa dividing the lesser omentum trough the avascular plane between the caudate lobe and the lesser curvature. The foramen of Winslow is accessed by placing a finger on the caudate lobe and sweeping it to the right, thereby encircling the hepatoduodenal ligament/porta hepatis through this foramen. Hereby, the hepatic pedicle is exposed to clamping.
With the advent of laparoscopy, this technique presented additional challenges, with limited abdominal access. First methods described an approach by several manners, that resulted inevitably in another incision.
More recent descriptions resume a total intracorporeal way of clamping by placing a tape around the pedicle, having entered the abdomen a trocar. Fixation of this tape is via clip. Although this technique surpasses others by preventing any different incisions, it still lacks easiness and reduced operative time, requiring the use of external materials as clips or locks.
In this video we present our way of accomplishing the Pringle maneuver by placing a shortened Foley tube with side hole on the tip through one of the port trocars. Then, the tail is pulled out through the side-hole to make a loop to encircle porta hepatis for inflow control. The friction prevents a loosened loop, hence there is no need of any other material. This method has been proving itself by reducing operative time for this surgical step and being undemanding for beginners. Another advantage is allowing intermittent clamping by releasing the tension of the loop through pulling the tip of the Foley tube.

Hepato-biliairy & pancreas—liver
V125—Laparoscopic left lateral hepatectomy for liver metastasis
Vasileios Drakopoulos, S. Voulgaris, N. Morfis, C. Kontovazainitis, V. Vougas
Evangelismos General Hospital, 1st Dep. of Surgery and Transplant Unit, Greece
Introduction: Laparoscopic surgery is gaining acceptance in the treatment of liver metastasis. Laparoscopic treatment of liver metastasis often presents technical difficulties and requires an extensive learning curve.
Material and Method: We present the case of a 62 year old woman presented with a liver metastasis in Sect. 3 of the liver. The patient had been submitted to a laparoscopic low posterior resection in February 2018. Patient underwent laparoscopic left lateral hepatectomy, with the use of three trocars (umbilical 10 mm, and two in the midclavicular line bilaterally.) Left lateral hepatectomy was conducted with the use of a linear stapler. The postoperative period was uncomplicated and the patient remains in good condition three months after surgery.
Conclusion: Laparoscopic approach seems to be safe for treatment of liver metastasis, offering better surgical field view and less postoperative complications. 5 year survival rate after laparoscopic hepatectomy is compared to the open approach.
Hepato-biliairy & pancreas—liver
V126—Clinical application of indocyanine green (ICG) fluorescence imaging to detect metastatic peritoneal nodules
Jai Young Cho, B Lee, H–S Han, HW Lee
Seoul National University Bundang Hospital, Surgery, Korea
Background: A recent study reported that resection of extrahepatic metastasis of hepatocellular carcinoma (HCC) in selected patients improving long-term survival. According to the improved preoperative imaging, sub-centimeter sized metastatic nodules are frequently detected, however, it is not easy to localize small extrahepatic nodules during surgery. The usefulness of intraoperative indocyanine green (ICG) fluorescence image for the HCC has been reported, while the study for detecting extrahepatic metastasis of HCC is rare.
In this report, we describe a case of HCC metastasizing to the peritoneum, which was detected by ICG.
Case report: A 50-year-old man was referred to our department for resection for suspected tumor implants from HCC. Three years before admission, he had undergone several times of transarterial embolization and radiofrequency ablation in segment 6, 8 and 2 (Child–Pugh A, Model for end-stage liver disease score, 10) Follow-up computed tomography revealed multiple perihepatic nodules. To confirm the pathology, we decided to proceed the diagnostic laparoscopy. ICG was intravenously injected at a dose of 0.025 mg/kg, 1 h preoperatively. When we performed the diagnostic laparoscopy under 3-dimentional scope (ENDOEYE FLEX 3D, OLYMPUS, USA), it was failed to detect perihepatic nodules. Then, we applied ICG fluorescent image system (ITS Model-L, InTheSmart Co. Ltd, Korea) ICG mode revealed the clear demarcation of nodule (Fig. 1). The tumor was resected using ultrasonic shears. The tumor was histologically confirmed as a metastatic HCC with focal sacromatoid feature.
Conclusion: ICG image can apply for the detection and efficiently resection of metastatic peritoneal tumors during laparoscopic surgery.
Hepato-biliairy & pancreas—liver
V146—Liver partition and portal vein ligation for staged hepatectomy (ALPPS): a case of ALPPS procedure with full robotic approach
E. Vicente, R. Caruso, Q. Yolanda, V. Ferri, H. Duran, H. Favra, E. Diaz, L. Malave, R. Agresott, V. Nola
HM Sanchinarro University Hospital, General surgery, Spain
The Associating Liver Partition and Portal Vein Ligation for Staged Hepatectomy (ALPPS) procedure is a new innovative surgical strategy aiming to potentially overcome the liver failure secondary to major liver resection. Robotic surgical technologies have been introduced with the goal of improving current outcomes from laparoscopic surgery, enhancing a surgeon’s dexterity in the surgical field through a magnified 3-dimensional view, instruments with 7 degrees of freedom and intuitive hand-control movements. This video shows the ALPPS technique performed with fully robotic support in a patient with bilobar liver metastatic disease secondary to colorectal carcinoma.
We describe the different technical aspects of the first and second stage of ALPPS procedure.
Hepato-biliairy & pancreas—liver
V147—Laparoscopic anatomic liver resection of a large Hepatocellular Carcinoma located in the postero-superior segments in a cirrhotic patient
Andrea Benedetti Cacciaguerra, E. Dalla Bona, M. Coletta, A. Vecchi, R. Rossi, Conte, D. Nicolini, F. Mocchegiani, M. Vivarelli
Polytechnic University of Marche, HPB and Abdominal Transplant Department, Italy
Introduction: Minimal invasive anatomic liver resection (MIALS) for hepatocellular carcinoma (HCC) located in the postero-superior segments can be challenging due to the difficult access and the increased risk of bleeding, especially in patients with liver cirrhosis. However special tips and tricks might help to overcome difficulties in performing a proper anatomic resection, ensuring safety and oncological efficiency, in particular when > 1 cm of clear negative margin is believed to be essential.
Method: The aim of this video is to present the technical aspects and the feasibility of MIALS of HCC in a cirrhotic patient located in segment VIII.
Results: The patient was a male of 66 years old man with a large lesion (55 mm) located in segment VIII. Medical history was characterized by liver cirrhosis (Child–Pugh score A6), diabetes mellitus II, metabolic syndrome, HBV + , mild portal hypertension. We performed a proper segment VIII MIALS with the identification and division of segmental inflow and outflow. The lesion was a 58 mm poor differentiated HCC with a resection margin > 10 mm (R0), without vascular invasion. Satellite nodule (5 mm) was detected next to the lesion within the resection margin (R0); METAVIR score 4. Operative time was 220 min with 150 cc of blood lost. Hospital stay was 4 days with no complications.
Conclusion: MIALS for large HCC located in the postero-superior segments in cirrhotic patients is feasible and offer the benefits of laparoscopic surgery. However, clear negative margin > 1 cm appears to be still necessary for the high risk of satellite lesions when considering liver resection for HCC.
Hepato-biliairy & pancreas—liver
V149—Pure laparoscopic liver posterior sectionectomy (PLPS): a surgery tutorial video with digital superimposition of key anatomy elements (VIDEO)
Raffaello Roesel, Lorenzo Bernardi, A. Cristaudi, F. Garofalo, F. Mongelli, D. Celio, P. Majno-Hurst, S.G. Popeskou
Regional Hospital of Lugano, Visceral Surgery, Switzerland
Background: Laparoscopic right posterior sectionectomy is a challenging procedure that requires both advanced surgical skills and a well-defined strategy. The main problems are the poor exposure of the surgical field because of the close proximity to the diaphragm and the difficulties with controlling hemorrhage during deeper parenchymal transection1. We present a laparoscopic right posterior sectionectomy using the Glissonean approach in a step by step technical video with digital superimposition of key anatomy points. Enhanced surgical videos, with easy insight to the different steps performed, represent a easy way to gain expertise on difficult surgical procedures2.
Methods: A 50-year-old man presented with an hepatocellular carcinoma at the passage between S6 and S7 in a non-cirrhotic liver. The patient was placed in a semi-lateral position with the lower limbs apart. After creating a 11-mm supra-umbilical port, pneumoperitoneum was established and maintained between 12 and 14 mmHg. Two working 11 and 12 mm trocars were placed in the right and left upper quadrant and two more working 5-mm trocars were placed under the xifoid process and in the lateral part of the right upper quadrant. Laparoscopic ultrasonography was used to precisely localize the tumor, to visualize adjacent hepatic vessels and to obtain an adequate tumor-free margin. After the cholecystectomy a complete mobilization of the right liver is obtained through a falciform, right triangular, coronary (anterior leaf) and Makuuchi3 ligament transection. The hepatoduodenal ligament was then encircled using an umbilical tape to perform the intermittent Pringle maneuver. The Inflow control is achieved by extra-parenchymal means with a glissonean approach. The right posterior portal pedicle and right branch of hepatic artery were dissected and temporally clamped with a bulldog clip to obtain ischemic delineation4. The demarcation line was then more precisely confirmed with intra-operative indocyanine green fluorescent imaging5 and marked on the liver capsule with diathermy hook. Parenchymal transection was subsequently performed by Thunderbeat scalpel (Olympus, USA) and Cavitron Ultrasonic Surgical Aspirator (CUSA) (Integra Lifesciences, New Jersey, USA) for superficial and deep parenchyma respectively. Hem-o-lock clips were used to control blood vessels and bile ducts with a size over 3 mm. A lipidic solution was injected on a retrograde fashion through the cystic stump for intraoperative bile leakage identification6. Final ICG test showed a perfectly vascularized liver remnant. The specimen was finally removed in a plastic endoscopic bag from a Pfannenstiel incision.
Results: The operation time was 593 min, the estimated blood loss was 300 mL and the total Pringle maneuver time was 107 min. Final histopathological diagnosis showed a 5.5-cm-sized well differentiated hepatocellular carcinoma with the resection margin measuring more than 1 cm (pt1b, V/L0, G1, R0). The patient was discharged on postoperative day 7 without any complications.
Conclusion: The Glissonean approach is feasible and safe for laparoscopic right posterior sectionectomy. ICG fluorescence imaging is a useful tool in deep liver resection with poor surgical-field view. The test with lipidic solution for intraoperative bile leakage identification is a promising tool that deserve future validation.
Bibliography:
Cho, J.Y., Han, H.S., Yoon, Y.S., Choi, Y. & Lee, W. Outcomes of laparoscopic right posterior sectionectomy in patients with hepatocellular carcinoma in the era of laparoscopic surgery. Surgery 158, 135–141 (2015).
Green, J.L., et al. The Utilization of Video Technology in Surgical Education: A Systematic Review. J Surg Res 235, 171–180 (2019).
Kogure, K., et al. Close relation between the inferior vena cava ligament and the caudate lobe in the human liver. J Hepatobiliary Pancreat Surg 14, 297–301 (2007).
Takasaki, K. Glissonean pedicle transection method for hepatic resection: a new concept of liver segmentation. J Hepatobiliary Pancreat Surg 5, 286–291 (1998).
Rossi, G., et al. Fluorescence guided surgery in liver tumors: applications and advantages. Acta Biomed 89, 135–140 (2018).
Liu, Z., Jin, H., Li, Y., Gu, Y. & Zhai, C. Randomized controlled trial of the intraoperative bile leakage test in preventing bile leakage after hepatic resection. Dig Surg 29, 510–515 (2012).
Hepato-biliairy & pancreas—Liver
V150—The more you see, the more you get: CEIOUS and ICG in the treatment of HCC of segment 7
Valentina D'Alessandro, R. Santambrogio, E. Galfrascoli, M.P. Giusti, M.A. Zappa
ASST fatebenefratelli, chirurgia generale, Italy
Background: Laparoscopic ablation therapies are a safe and effective technique for the treatment of hepatocellular carcinomas not suitable for resection. The usage of contrast enhanced intra operative ultrasound (CEIOUS) can improve the complete ablation rate of tu¬mors, identifying new satellite nodules. The role of indiocyanine green (ICG) in this setting is still under study. The combination of CEIOUS and ICG could enhance the possibility of defining better the HCC limits and discovering new satellites, in order to expand the treatment and the outcome.
Materials and Methods: In our video we present a case of CEIOUS and ICG guided laparoscopic microwave ablation of HCC in segment 7 in a 77 yo man, affected by chronic NAFLD, detected during the follow up after several previous percutaneous radiofrequency ablations for recurrences in the same location. Preoperative CT scan showed a 50 mm single mass in segment 7 countiguous to the right hepatic vein. The patient was not eligible to major hepatectomy due to age, size of the mass and tumor location.
Results: On the basis of IOUS and ICG evaluation, we performed four infissions of MW antenna (exposure time respectively 10’,6’,5’ and 3’) with a power of 90 W. At a further evaluation with CEIOUS a small residual area of arterial enhancement was detected, and a new infission was performed. The postoperative CT scan taken on PO day 4 showed a large non enhancing area with a doubtful small residual tumor go 16 mm next to the RHV.
Conclusions: CEIOUS and ICG can be combined ad safely used intraoperatevely to improve detection and treatment of hepatic lesions in laparoscopic settings. Further studies are needed to assess the benefit of this combined approach.
Hepato-biliairy & pancreas—Liver
V151—Indocyanine green fluorescence navigation for anatomical laparoscopic segment 6 hepatectomy
Benedetto Ielpo, F Burdio, P Sanchez, E Pueyo, A Martinez-Solá, L Grande, M Pera
Hospital del Mar, General Surgery, HPB Unit, Spain
Aims: To show the role of indocyanine green (ICG) fluorescence navigation in laparoscopic hepatectomy and its intraoperative influence for anatomical liver resection.
Methods: This procedure was performed on a 67-year-old man with a 5 cm sized hepatocarcinoma mass in the segment 6. The CT scan showed the pedicle of the segment 6. We planned the intraoperative identification of the 6 pedicle thought ultrasound, checking its correct identification using the ICG.
Results: After creation of a pneumoperitoneum via a 12 mm infra-umbilical port, 5 additional trocars are inserted. As showed in the video, surgery is started with laparoscopic ultrasound and identification of the pedicle of the 6 segment that is finally dissected. We injected ICG intravenously before and after clamping the segment 6 pedicle. The liver was observed under visible light and under near-infrared light showing the lack of perfusion of segment 6, assuring the correct identification of its pedicle.
Thereafter, the liver segment is resected following the ICG margins.
Conclusions: ICG fluorescence navigation is safe and efficient in laparoscopic hepatectomy. It helps to better identify liver segment pedicles assuring surgical margins.
Hepato-biliairy & pancreas—Liver
V152—ICG Guided robotic anatomical Liver S 3 resection for epithelioid pleomorphic tumor
Marco Montagna, V. Ferraro, R. Memeo, M. Tedeschi, N. De Angelis1, G. Bianchi1, A. LibiaIBIA, M. Conticchio, A. Delvecchio, A. Casella
"F. Miulli Hospital" -Acquaviva delle fonti (Bari) Italy, Hepato-Pancreato-Biliary Surgery Unit, 1colorectal surgery Unit, Italy
Background: Despite its relatively recent introduction in clinical practice, robotics has been accepted as an effective option to perform high-demanding procedures such as those required in hepatobiliary surgery.
Methods: we describe the clinical case of a 38 years-old woman with a left liver lesion with rapid increase in size symptomatic with dysphagia and weight loss and with negative neoplastic markers.
Her past surgical and medical story were unremarkable. CT scan and MRI showed a 10 cm lesion causing stomach compression.
Ultrasound is considered the best tool to identify anatomic landmarks and the transection during liver surgery but it is not the only one. Indocyanine green (ICG) is a fluorescent dye that has been widely used for fluorescence imaging during hepatobiliary surgery. ICG is injected intravenously, selectively uptaken by the liver, and then secreted into the bile ducts. The catabolism and fluorescence properties of ICG permit a wide range of visualization methods in hepatobiliary surgery. In this surgery we simultaneously used intraoperative ultrasound, preoperative and intraoperative indocyanine green and selective clamping of the left hepatic artery and S3 sectorial artery to conduct the resection. The use of intraoperative indocyanine green allowed us to promptly modify the section margin.
Results: The patient's clinical course was regular and discharged 3 days after surgery.
Conclusions: Robotic approach can brigde the gap between the complexity of liver resections and the minimally invasive surgery.
Hepato-biliairy & pancreas—Liver
V153—Syndrome with cholecystocholedocal fistula type II
Clara Galan Martinez, J. Ye, M. Rodriguez, B. Martin, V. Molina, A. Moral, S. Sanchez Cabús
Hospital de la Santa Creu i Sant Pau, Cirugiá General y del Aparato Digestivo, Spain
Aims: To show the surgical treatment of a patient with Mirizzi syndrome (MS) with a type II cholecystocholedochal fistula.
Methods: We present a video of laparoscopy choledocholithiasis extraction, bile duct examination with choledoscope and laparoscopic cholecystectomy in a 77-year-old female with MS who presents abdominal pain.
Results: This video shows a scleroatrophic gallbladder and prominence of choledocholithiasis in the biliary tract. Choledochotomy is performed with extraction of large choledocholithiasis. The examination was completed with choledochoscopic examination, visualising the distal bile duct up to the papilla and proximal to the common hepatic duct and its division, with no further choledocholithiasis. Kehr drain was placed and choledocholithiasis raffia was performed. The cholecystectomy was completed. The operating time was two hours.
The patient was hospitalized for four days after surgery. She had a good evolution. There weren’t postoperative complications.
Conclusions: MS is a rare entity, present in 0.7–2.7% of cholecystectomies. It is associated with an increased incidence of gallbladder cancer.
Its preoperative diagnosis is difficult to establish, but it helps to determine the type of surgical strategy depending on the existence of the biliary fistula and its characteristics.
In this video we want to show that patients with MS can benefit of the minimally invasive approach with lapraroscopic common bile duct exploration. This approach can be carried out safely with aceptable morbidity and mortality in patients that have been adequately selected.
Hepato-biliairy & pancreas—pancreas
V001—Pure laparoscopic pancreatico-duodenectomy with laparoscopic total nephrectomy
Beniamino Pascotto, C. Infante, L. Arru, M. Goergen, J.S. Azagra
Centre Hospitalier de Luxembourg, General Minimally Invasive (Laparoscopic and Robotic) Surgery
This video shows a pancreatico-duodenectomy with right nephrectomy by laparoscopic approach. The patient is a 73 years old woman with duodenal liposarcoma and an accidental CT-Scan finding of a tumor in the upper right kidney pole. After multidisciplinary discussion we decided to perform a minimally invasive one-time surgery.
The video shows the mains step of the operation. During the dissection time we perform the pancreaticoduodenectomy and after that the right nephrectomy. During the reconstruction time we perform the 3 anastomoses: pancreatico-jejunostomy, hepatico-jejunostomy and gastro-jejunostomy.
The patient started to drink the same day of the operation and to eat the 1st postoperative day. The amylases drain dosage at the 3th postoperative day was normal and the drain has been removed at the 4th postoperative day. The patient has been discharged the 10th postoperative day.
Hepato-biliairy & pancreas—pancreas
V002—Total laparoscopic pancreatectomy in a patient with synchronous solid pseudopapillary neoplasm and intraductal papillary mucinous neoplasm of pancreas
Vasileios Drakopoulos, N. Roukounakis, K. Mpotsakis, S. Voulgaris, V. Vougas
Evangelismos General Hospital, 1st Dep. of Surgery and Transplant Unit, Greece
Aim: To report and discuss the first case in the literature of a 39-year-old pregnant woman suffering synchronous solid pseudopapillary neoplasm (SPN) and intraductal papillar mucinous neoplasm (IPMN) of pancreas treated successfully with total laparoscopic pancreatectomy postpartum.
Method: A 39-year-old woman was admitted to our hospital due to abdominal pain. The CT-scan demonstrated a mixed type lesion (solid-cystic) in the body to tail of pancreas. The EUS-FNA was not diagnostic. One month later the PET-scan confirmed the CT-scan finding and the presence of a fetus. At this time the patient refused any surgical intervention. After her childbirth the new investigation (CT-scan, PET-scan, EUS-FNA) revealed the presence of synchronous SPN and IPMN of pancreas. She underwent total laparoscopic pancreatectomy using 6 trocars (one 10 mm in umbilicus as it is introduced in single incision laparoscopic surgery, one hypoxiphoid 12 mm, 2 suprapubic 5 mm, 2 in the middle clavicle line 5-12 mm proximally to the suprapubics ones.
Results: The microscopic examination confirmed the synchronous presence of two distinct primary neoplasms of the pancreas. A branch-duct type papillary mucinous neoplasm of the head of the pancreas of gastric type and a solid pseudopapillary neoplasm in the body to the tail of the pancreas. The postoperative period was uncomplicated. Nine months after the operation the patient is in good health and according to MRI investigation disease free.
Conclusion: The synchronous presence of SPN and IPMN has reported only in two cases, both in men, until now. The existence of SPN in pregnancy has been discussed in the view of potential rapid growth and spontaneous rupture of the lesion. No IPMN lesion has been reported in pregnancy. Laparoscopic total pancreatectomy constitutes an effective and safe minimally invasive surgical procedure. Many studies have shown its advantages compared to open surgery regarding blood loss and hospital stay.
Hepato-biliairy & pancreas—pancreas
V003—Spleen preserving laparoscopic distal pancreatectomy for insulinoma
Gil Faria, P. Valente, L. Barbosa, R. Peixoto
ULS Matosinhos/Hospital Pedro Hispano, Surgery, Portugal
Insulinoma is the most frequent producing pancreatic neuro-endocrine tumour. Its presence is clinically suspected by the Whipple triad (symptoms on fasting or exertion, low glycemia and symptom reversal with glycaemic correction). Hypoglycaemic symptoms are non-specific and might range from irritability to convulsions and coma.
Insulinomas are usually small tumours (1–1.5 cm) that appear in the 5th decade of life. They might appear throughout the pancreatic gland and are usually benign and solitary. The clinical suspicion should be validated by measuring insulin and its precursors in prolonged fasting. Most lesions are identified on CT or MRI and their treatment is surgical resection.
We present the case of a 35 years-old man with several episodes of hypoglycaemia that lead to hospital admission. The symptoms were reversed with glucose control. Lab values for insulin, pro-insulin and C-peptide were increased after prolonged fasting and the MRI revealed a solid, 24 mm lesion in the pancreatic body. The patient was proposed for laparoscopic distal pancreatectomy with spleen preservation.
The surgery and post-operative were uneventful, and the patient was discharged on the 5th post-operative day. The histological report revealed a pancreatic neuro-endocrine tumour with staining for insulin and the patient has been euglycemic ever since.
Surgical resection is the cornerstone of treatment for pancreatic NETs and the minimally invasive approach allows for a faster recovery with increased patient satisfaction.
Hepato-biliairy & pancreas—pancreas
V004—Laparoscopic double bypass in unresectable pancreatic cancer
Maciej Matyja, M. Pedziwiatr, P. Major, A. Matyja
Jagiellonian University Medical College, 2nd Department of General Surgery, Poland
Introduction: Laparoscopy in management of pancreatic cancer still remains controversial. However, it might be used not only as a diagnostic tool but it is also effective in palliative surgery.
Aim: The aim of this video is to demonstrate the application of laparoscopic surgery for the unresectable pancreatic cancer.
Methods: Patient is a 67 year- old female (BMI of 24,1 kg/m2) with unresectable pancreatic cancer infiltrating the mesentery, who presented massive weight loss, jaundice (bilirubin > 400 umol/l). The level of Ca 19–9 was 2630 U/ml. Patient underwent unsuccessful attempt of stenting the common bile duct during endoscopic retrograde cholangiopancreatography and was scheduled for laparoscopic bypass anastomoses.
Results: Patient tolerated the procedure well. Intraoperatively: infiltration of the mesentery was confirmed. Laparoscopic cholecystectomy and two anastomoses were performed: choldeochojejunostomy and gastrojejunostomy. In postoperative period no complications were noted. Patient was discharged from the hospital on the 7th day post-op.
Conclusion: Laparoscopic surgery for unresectable pancreatic cancer may be efficient and used as a form of palliative treatment. Additionally, minimally invasive techniques could accelerate introduction of chemotherapy.
Hepato-biliairy & pancreas—pancreas
V005—Laparoscopic surgical treatment of the pancreatic pseudocysts: therapeutic options
Daniel Coronado Llanos, A. Centeno, C. Mühlenberg, S. Gonzalez, R. Ribas, C. Lopez, J. Sala
Hospital Sant Joan Despì Moisès Broggi, General Surgery, Spain
Aims: The pancreatic pseudocyst is the collection of pancreatic secretions with the consequent formation of a fibrous wall, all secondary to acute or chronic inflammatory changes of the pancreas. In symptomatic cases, treatment may consist of percutaneous, endoscopic, or surgical drainage. The aim of this paper is to present and compare two surgical options regarding the treatment of pancreatic pseudocysts, using a laparoscopic approach.
Methods: Two patients with symptomatic pancreatic pseudocysts were eligible to surgical treatment. The following video shows step by step two minimally invasive surgical techniques. In the first case was performed a retrogastric cystogastrostomy approach and in the second, a transgastric cystogastrostomy. Both techniques were performed at the same surgical time as cholecystectomy.
Results: Both surgeries were completed laparoscopically and performed without complications, with a short length of hospital stay. The control radiological tests had shown the complete resolution of the pancreatic pseudocysts.
Conclusions: In patients with indications for surgery, the location of the pseudocyst conditioned the surgical technique to be used. With proper patient selection, the laparoscopic approach in the treatment of symptomatic pancreatic pseudocysts is a safe alternative, associated with low morbidity and a short length hospital stay.
Hepato-biliairy & pancreas—pancreas
V006—Real robotic enucleation of uncinate pancreatic process insulinoma
Beniamino Pascotto, Ali Daher, L. González González, B. Pascotto, V. De Blasi, F. Dadoun, J.S. Azagra
Centre Hospitalier de Luxembourg, General Minimally Invasive (Laparoscopic and Robotic) Surgery, Luxembourg
The video is about a 42 years old man with no medical history until 2017 when he underwent a medical set up for hypoglycemia. He started a medial treatement with good results. In July 2020 his clinical condition worsened with hypoglycemic crisis hard to control and more symptomatic. CT-Scan and magnetic resonance showed a 2 cm insulinoma localized in the uncinate process of the pancreas. A robotic operation has been planned.
The patient underwent a full robotic uncinate process resection. The operation ended with no complications.
The patient started to drink the same day of the operation and to eat the 1st postoperative day. He has been discharged the 3rd postoperative day. The biological tests showed a serum level of proinsuline passing from 80–100 pmol/l preoperatively to < 20 pmol/l postoperatively. The hystological results showed a well differentiated neuroendocrine tumor (G1) with a Ki67 4% compatible with an insulinoma.
Hepato-biliairy & pancreas—pancreas
V058—Laparoscopic radical antegrade modular pancreaticosplenectomy and left adrenalectomy in MEN 1
Marco Raffaelli, Francesco Pennestrì, C. De Crea, F. Pennestrì, F. Greco, F. Zotta, R. Bellantone
Fondazione Policlinico Universitario Agostino Gemelli IRCCS, Università Cattolica del Sacro Cuore, Division of Endocrine and Metabolic Surgery, Italy
Aims: Surgical management of pancreatic lesions in Multiple Endocrine Neoplasia 1 (MEN1) is challenging. Laparoscopic posterior radical antegrade modular pancreaticosplenectomy (pRAMPS) has been introduced in the setting of pancreatic cancer treatment to improve the resection margin and the extent of lymph node dissection. We report a case of MEN 1 with synchronous pancreatic and left adrenal lesions.
Methods: A 41-year-old man who had previous subtotal parathyroidectomy was diagnosed with MEN1 (heterozygous exon 9 c.1252_1254delGACinsAT mutation). The biochemical screening detects an insulinoma further confirmed by the CAT scan that identify two pancreatic lesions (5 and 1.5 cm in the body-tail with celiac axis lymph node involvement) and a 4.5 cm left adrenal lesion. A laparoscopic en bloc distal pancreaticosplenectomy and left adrenalectomy and lymph node dissection.
Results: The patient was positioned in partial (45°) right lateral decubitus. A 4 trocars laparoscopic approach was performed. The pRAMPS was accomplished according the clockwise technique. The first step of the surgical procedure was a wide dissection of the left colon flexure. Then, the inferior border of the pancreas is exposed by opening the lesser sac. Afterwards, the dissection is continued along the inferior pancreatic edge until the lateral aspect of the inferior mesenteric vein. The pancreas, the splenic artery and vein, are then individually divided by the means of a stapler. Dissection is then continued along the superior and inferior margin of the pancreas in a dipper plane of dissection including the adrenal. The left renal vein is exposed and the main left adrenal vein is dissected between clips. The adrenal dissection is completed along the medial and lateral aspect. The lateral attachment of the spleen is dissected. En bloc distal pancreaticosplenectomy and left adrenalectomy with para-aortic, peri-pancreatic and celiac axis lymph node dissection is completed. A mini-laparotomy (Pfannestiel) is used to remove the operative specimen in retrieval bag. Postoperative course was uneventful. The histopathological reported a multifocal G2, pT3(m) pN1(2/29) endocrine neoplasia and adrenocortical oncocytic adenoma.
Conclusions: The concept of pRAMPS following a deep plane of dissection may represent an option treatment in MEN 1 patients with synchronous pancreatic and left adrenal lesion.
Hepato-biliairy & pancreas—pancreas
V059—Laparoscopic total remnant pancreatectomy after laparoscopic pancreatoduodenectomy with or without splenectomy
Hiroki Sunagawa, K. Hayashi, K. Omori
Nakagami Hospital, Department of Surgery, Japan
Background: A total pancreatic resection for remnant pancreatic cancer offers the best chance for curability. Recently, distal pancreatectomy and pancreaticoduodenectomy for pancreatic cancer have been performed laparoscopically. However, even open surgery total remnant pancreatectomy after pancreaticoduodenectomy (PD) is a difficult procedure. Furthermore, laparoscopy is difficult because the organ reconstruction created at the initial surgery. Recently, the incidence of intraductal papillary mucinous neoplasms (IPMNs) has increased. The occurrence of synchronous or metachronous multifocal IPMNs is observed in approximately 20% of patients. In this situation, there have been a few reports of repeated laparoscopic pancreatectomy for remnant pancreatic cancer after laparoscopic PD. Laparoscopic total remnant pancreatectomy (LTRP) is not yet popular. Herein, we employ LTRP with spleen preservation and describe the usability of this laparoscopic procedure with a video.
Methods: All patients provided informed consent and this study was approved by the Institutional Review Board of Nakagami Hospital (IRB2020031). We performed LTRP either with or without splenectomy to achieve tumor-free margins. In LTRP without splenectomy, we checked the blood flow of the spleen using laparoscopic echogram. Two patients underwent LTRP for left-sided pancreatic cancer: one in May 2011, and the other in April 2020. This video shows our LTRP without splenectomy procedure performed in a 73-year-old woman with pancreatic body cancer who was being followed up after PD 8 years prior, with a modified Child’s reconstruction, for intraductal papillary mucinous carcinoma. The histopathological diagnosis of this tumor was pStage IIa according to the 7th edition of UICC classification. The second tumor was suspected to be cStage IIa. A total laparoscopic approach with five ports was employed for this procedure. Using laparoscopic ultrasonography, we confirmed that the tumor was inside the pancreas and the lack of hepatic metastasis. We first detected and cut the jejunum between the sides of the pancreatodudenectomy and the choledocojejunostomy. The SA was detected at the tail side and returned to the root of the SA and clipped. We confirmed blood flow of the spleen and cut the splenic hilum for spleen preservation. Next, we accessed and opened the retro-pancreatic space. The most dangerous side lays around the SMV.
Especially SMV was adhered to the remnant pancreas firmly. So we lifted both the cut side of the jejunum and pancreatic tail to confirm between SMV and remnant pancreas. A retro-pancreatic horizontal approach same as the running angle of SMV is more advantageous for laparoscopic than for open approaches. After resection of the adhesion between the SMV and remnant pancreas, we resected the SA and vein, thus removing the specimen.
Results: Surgery time was 297 min, and estimated blood loss was 100 ml. The postoperative course was uneventful, and the patient was discharged on postoperative day 10. Pathological examination revealed invasive ductal carcinoma (stage IIa according to the 7th UICC classification) with tumor-free margin. And first patient underwent LTRP with splenectomy without complications.
Conclusions: LTRP after laparoscopic pancreatoduodenectomy is feasible and safe because of the specific horizontal field of view of laparoscopy. Nevertheless, we advocate long-term follow-up, and the accumulation of further similar cases will be needed to confirm our findings.
Hepato-biliairy & pancreas—pancreas
V060—Standardization of laparoscopic pancreato-duodenectomy at our center. Resection step
Benedetto Ielpo, F. Burdio, P. Sanchez, E. Pueyo, A. Martinez-Solá, L .Grande, M. Pera
Hospital del Mar, General Surgery, HPB Unit, Spain
Aims: Laparoscopic pancreatoduodenectomy (PD) has recently increased worldwide. However, this procedure is technically challenging and it still needs to be standardized.
We herein describe a standardized, step-by-step approach of the laparoscopic PD at our center highlighting some technical tips and tricks.
Methods: This procedure was performed on a 69-year-old man with a 3 cm sized adenocarcinoma mass in the head of the pancreas.
Results: After creation of a pneumoperitoneum via a 12 mm infra-umbilical port, 6 additional trocars are inserted. As showed in the video, surgery is started with division of the greater omentum. The dissection moves from medial to lateral up to a wide Kocher maneuver. Thereafter, the liver hilum is dissected with lymphadenectomy and section of gastroduodenal artery. The jejunum is transected and moved to lateral behind superior mesenteric vessels. After gastric section, a window is opened between the pancreas and superior mesenteric vein. The pancreas is transected and mesopancreas is dissected through Ligasure and radiofrequency devise (Coolingbis).
Conclusions: Laparoscopic PD procedure can be a safe and feasible technique in experienced centers with advanced minimally invasive skills; it is recommended to standardize the technique for teaching purposes, replicability and to ensure patient safety.
Hepato-biliairy & pancreas—pancreas
V061—Laparoscopic total pancreatectomy pancreatic head tumour
Justyna Rymarowicz, A.Z. Rzepa, T. Wikar, P. Matyja, M. Pisarska-Adamczyk, M. Pędziwiatr
Jagiellonian University Medical College, 2nd Department of General Surgery, Poland
With the widespread use of radiologic imaging as well as the recent improvements in the understanding of the pancreatic cancer pathogenesis, the number of indications for total pancreatectomy increased in the recent years. Further, the advancement in the postoperative care and a better diabetes management significantly contributed to the decreased postoperative mortality.
Despite clear advantages of laparoscopic approach used in other gastrointestinal tumour resections, laparoscopic total pancreatectomy remains a relatively rarely performed procedure.
We present a case of a 72 years old female with the mass in the pancreatic head and biliary obstruction treated by a self-expandable stent. Considering the patient’s preferences, a decision was made to perform a laparoscopic total pancreatectomy. Patient suffered from brittle, insulin dependent diabetes mellitus preoperatively and by avoiding the pancreatic anastomosis in total pancreatectomy would decrease the common postoperative complication.
This video presents a step by step approach to laparoscopic total pancreatectomy for pancreatic head tumour adjacent, but not infiltrating the superior mesenteric vein. Preparation had been made for the partial superior mesenteric vein resection at the instance of tumour infiltration. A side-to-side stapled antecolic anterior gastrojejunostomy and a hepaticojejunostomy using V-lock sutures were performed.
Hepato-biliairy & pancreas—pancreas
V062—Pure Laparoscopic Radical Antegrade Modular Pancreato-Splenectomy (RAMPS) procedure. Standardization of the technique
Benedetto Ielpo, F. Burdio, P. Sanchez, E. Pueyo, A. Martinez-Solá, L. Grande, M.Pera
Hospital del Mar, General Surgery, HPB unit, Spain
Aims: Laparoscopic left pancreatectomy for pancreatic cancer has recently increased worldwide. With the attempt to improve its oncological safety by enlarging the resection margins, the radical antegrade modular pancreato-splenectomy (RAMPS) have been introduced. However, this procedure is technically challenging and it still needs to be standardized.
We herein describe a standardized, step-by-step approach of the laparoscopic RAMPS at our center highlighting some technical tips and tricks.
Methods: This procedure was performed on a 59-year-old man with a past history of diabetes and hypertension with non-specific abdominal pain. In the CT scan a 3 cm sized low attenuated mass in the body of the pancreas was detected with suspicious invasion of the posterior capsule.
Results: After creation of a pneumoperitoneum via a 12 mm infra-umbilical port, three additional trocars are inserted. As showed in the video, surgery is started with division of the greater omentum. The inferior pancreatic border is dissected until the superior mesenteric vein and the origin of the splenic vein are exposed. Thereafter, the splenic artery and vein are dissected and divided. A window is opened between the pancreas and splenic vessels, and the neck of the pancreas is transected. The left side of the superior mesenteric artery is exposed until the left renal vein is identified. The retroperitoneal dissection continues along the anterior surface of the renal vein and kidney.
Conclusions: Laparoscopic RAMPS procedure is a safe and feasible technique in experienced centers with advanced minimally invasive skills; it is recommended to standardize the technique for teaching purposes, replicability and to ensure patient safety.
Hepato-biliairy & pancreas—pancreas
V063—Robotic central pancreatectomy with double pursestring pancreaticogastrostomy and Wirsung's duct stent for pancreatic neuroendocrine tumor
Annarita Libia, M. Montagna, M. Tedeschi, V. Ferraro, A. Casella, G. Bianchi, N. De Angelis, N. Chetta, R. Memeo
Hospital F. Miulli, Hepatobiliary and Pancreatic Surgery Unit, Italy
Background: Central pancreatectomy is a surgical procedure that allows to resect benign and low-grade malignant tumors located in the isthmus or proximal body of pancreas, with the advantage of sparing normal pancreatic parenchyma. For pancreatic neuroendocrine tumors (pNETs), central pancreatectomy can be an appropriate option, whenever surgery is required. Methods: A 68-year-old man was admitted to our unit for the treatment of a 2.5 cm lesion located at the isthmus of pancreas. The daVinci Xi robot was used. The surgical procedure started with double gastric hanging maneuver, exposing the pancreatic gland; then, the pancreatic neck was transected using a laparoscopic stapler with bioabsorbable reinforcement. The pancreatic body was progressively mobilized from right to left and sectioned after careful intraoperative ultrasound in order to achieve a negative resection margin. The remaining pancreatic stump was managed through a double pursestring invaginated pancreaticogastrostomy and external drainage of Wirsung's duct via Bracci catheter. A close suction drain was left in place. Results: The operative time was 240 min, blood loss was 200 cc, no blood transfusion was necessary. The patient began fluid intake on postoperative day (POD) 6 and solid food intake on POD8, he was discharged on POD 12. Pathological findings of the specimen confirmed a well-differentiated pNET with R0 resection margin. Two weeks after the discharge, the patient was re-admitted to hospital complaining fever and abdominal pain. The blood tests showed leukocytosis and elevation of C-reactive-protein. The abdominal CT-scan revealed a 90 × 20 mm encapsulated peripancreatic collection with peripheral enhancement. Percutaneous drainage was performed and the sample colture detected E. Cloacae complex, thus endovenous anthibiotics were administered. One week later, abdominal ultrasound revealed the complete resolution of the collection. Two months after the surgical procedure, the patient was submitted to upper endoscopy for epigastric pain which confirmed the optimal status of the pancreaticogastrostomy. Three months after surgery, the patient underwent by himself a thoraco-abdominal CT-scan which confirmed complete resolution of the pancreatic fistula.
Conclusions: Central pancreatectomy can be considered a valid surgical option for well-differentiated pNETs. Evidence in literature is still scarce but the results reported till now are encouraging. The risk of pancreatic fistula remains concrete, but its management can be successful with timely minimally invasive approach.
Hepato-biliairy & pancreas—pancreas
V168—Kimura technique by laparoscopic aproach
Bakarne Ugarte-Sierra, Irune Vicente Rodríguez, N. Ortega Machón, A. Cavero Ibiricu, A. Sanz Larrainzar, L. García Bruña,, R. Maniega Alba, F.J. Ibáñez Aguirre
Hospital Universitario De Galdakao, General Surgery, Spain
Aim: Show kimura technique by laparoscopic aproach.
Methods: description in video presentation.
Results: We show a female case suffering a intraductal papillary mucinous tumor to whom a kimura technique by laparoscopic approach was performed.
Conclusions: The pancreatic resection by laparoscopic approach can be an safe and feasible option in selected cases.
Hepato-biliairy & pancreas—pancreas
V170—Combined laparoscopic cystogastrostomy and cholecystectomy: a case report and review of current operative management
Alexandrina Braniste, Ho Lun Chong, P. Sodde, A. Jamil1, A. N. Wilson, M. A. Khan, A. Warsi
University Hospitals of Morecambe Bay NHS Foundation, General Surgery, 1Laparoscopic, Upper GI and General Surgery, United Kingdom
Background: Laparoscopic cystogastrostomy and laparoscopic cholecystectomy are well-established minimal access procedures to treat pancreatic pseudocysts or pancreatic fluid collections persisting more than 6 weeks following biliary pancreatitis. These two procedures are often performed in two separate sittings. However, it is suggested that early cholecystectomy raises the risk of contamination of the peripancreatic fluid, as well as subjecting the patient to undergo two interventional procedures under general anaesthetic. With increasing surgeon experience and development of laparoscopic techniques, laparoscopic procedures can now be performed in conjunction. To the best of our knowledge, this is the second report in medical literature exploring the feasibility of a combined cystogastrostomy and cholecystectomy within a standard setting.
Methods: We report the case of a 76-year-old male with a large pancreatic pseudocyst originating from the midbody of the pancreas, diagnosed 3 months after an acute case of pancreatitis. The patient underwent a cystogastrostomy and cholecystectomy in the same sitting. Trocars were inserted using the standard 5-port extended laparoscopic cholecystectomy (LC) technique (10–10-5–5-5). Anterior and posterior gastrostomies were established with a harmonic scalpel to access the anterior wall of the pseudocyst, which was then drained. A nasogastric tube was inserted into the pseudocyst cavity to continue draining post-operatively. Laparoscopic cholecystectomy was then performed.
Results: No complications were registered during the early postoperative period. The patient was discharged shortly on postoperative day 7 in a comfortable condition, suggesting excellent patient experience of the procedure. No reports of recurrence following the procedure were registered during the 12-month follow up period.
Conclusion: Performing laparoscopic cystogastrostomy and cholecystectomy in conjunction is a safe and feasible technique for the management of pancreatic pseudocysts. The simultaneous operative management avoids the risks associated with a second procedure and furthers the inherent benefits of minimal access surgery.
Hepato-biliairy & pancreas—pancreas
V183—Anatomical landmarks, tips and tricks of laparoscopic “Splitted” total pancreatectomy for chronic pancreatitis
Andrea Coppola, M. De Capua, N. Pirozzi, C. Caricato, R. Peltrini, E. Pontecorvi, V. Silvestri, U. Bracale, F. Corcione
A.O.U. Federico II, Department of Public Health, Minimally invasive General and Oncologic Surgery Unit, Italy
Aims: Despite difficulty in patients’ selection and potential severe postoperative morbidity, total pancreatectomy (TP) is a valid option for chronic pancreatitis (CP) with severe pain not responding to medical treatment. Laparoscopic approach for TP provides all benefits of the minimally invasive procedures, however it is considered a complex surgical procedure and it has rarely been reported on literature. This educational video presents a case of laparoscopic “Splitted” TP (STP) focusing on anatomical landmarks and tips and tricks. In our current practice, STP is a standardized procedure that improves feasibility and safety of TP. The adoption of this technique can help guiding the surgeon intraoperatively, improving the learning curve and patients’ outcomes.
Methods: A 50-year-old man with history of one-year epigastric pain has been diagnosed with chronic pancreatitis by abdominal CT scan and MRI. Since the patient did not respond to medications, a laparoscopic STP has been performed. The technique consists in a systematic pancreatic section at the level of the neck. This step allows to divide surgery in two surgical stages by performing a spleno-distal pancreatectomy and duodenopancreatectomy separately. This is an easier way to complete the resection and a safer method to detect the splenic artery and vein at their origin along with all vascular structures identified before section.
Results: Operative time was 480’. No post-surgical complications occurred. The patient was discharged at the fifteenth postoperative day. Pathology confirmed diagnosis of chronic pancreatitis and he is in good condition, takes insulin therapy and pancreatic enzymes replacement therapy after 6 months of follow up.
Conclusions: This video shows that a laparoscopic STP is a feasible and reproducible technique even for young surgeons. Recognizing anatomical landmarks is mandatory for the intervention and a standardised approach can be useful as well as to separate a complex demolitive procedure in two different surgical stages.
Hepato-biliairy & pancreas—pancreas
V210—Insulinoma: intraoperative ultrasonography use in minimally invasive pancreatic resection. a case report
Luisana Riba Combatti, S. González Martínez, H .Gómez Facundo, Y. Gobbini, P. Gil Millán, J. Castellví Valls, G. Galofré Pujol
Aims: Insulinoma is an insulin-secreting tumor originating from the pancreatic b-cells, resulting in hypoglycemia. Although this is the most common functional pancreatic tumor, insulinoma is very rare, with an annual incidence of four cases per million. Most insulinomas are located in the pancreas, while extra-pancreatic insulinoma has been reported.
Surgical removal continues to be the treatment of choice. Preoperative localization imaging is mandatory in planning surgical approach. Intraoperative laparoscopic ultrasound can detect 90% of insulinomas and reinforces the indication of minimally invasive surgery technique. The aim of this study is to confirm the value of laparoscopic ultrasonography as an aid in locating pancreatic insulinoma and making feasible minimally invasive surgical approach.
Methods: Case report: 52 yo male with a history of hypertension, class II obesity and recently labeled with “epileptic syndrome”. Presents to the ER with symptoms of weakness, stupor, focal seizures and amnesia. Blood test results showed: glucose 22 mg/dl, INS 37.70 µU/mL, PROIN: 8.3 pmol/L, HAb1c 4.8%. Symptoms were relieved when glucose levels were raised (Whipple’s triad).
Abdominal CT scan shows the presence of a 13 mm pseudonodular hypervascular tumor, located in the inferior part of the pancreatic body. Pancreatic MRI confirmed the presence of a nodule at the inferior border of the pancreatic body hyper intense in T2 and hypo intense in T1, with marked restriction on diffusion.
Results: Elective laparoscopic enucleation was scheduled. Peroperatory laparoscopic ultrasonography allowed identifying a 1.4 cm tumor in the lower border of the pancreatic body. Complete enucleation was performed respecting the main pancreatic duct. There were no postoperative complications. The surgical pathology report confirmed a 2 × 1,5 cm well differentiated neuroendocrine tumor, grade 1 cell proliferation rate (Ki-67 = 1%) with clear margins. At 6-month follow-up the patient remains asymptomatic, with normal glucose levels. Anti-seizure medication has been successfully stopped.
Conclusions: Surgical resection is the treatment of choice for solitary benign insulinomas. Accurate preoperative and intra operative localization of insulinomas is essential for successful surgical treatment. Laparoscopic ultrasonography is highly sensitive in localizing the pancreatic tumor, making minimally invasive surgical feasible and safe.
Hepato-biliairy & pancreas—pancreas
V211—Totally laparoscopic treatment of DPDS (disconnected pancreatic duct syndrome) in patient with giant pancreatic head pseudocyst
Alexander Voynovskiy, E. Belykh, D. Mudryak, M. Tokarev
I.M. Sechenov First Moscow State Medical University, Abdominal, Russia
Introduction: DPDS is one of the frequently overlooked complications of acute pancreatitis. That’s why it’s an open and actual problem. Currently, it is not fully known which is preferable: early surgical intervention or step up approach.
Aims: To show an effective method for treating giant pancreatic head pseudocyst when minimal invasive approach is inefficient.
Methods: Male born in 1984 with giant pancreatic head pseudocyst (PC). In anamnesis: some cases of acute pancreatitis with conservative treatment. Real exacerbation started with jaundice, growing up nausea and vomiting. On CECT there is a pancreatic head pseudocyst 100 × 155 mm which is heterogeneous due to septums and big soft tissue inclusion (26 cm3) without contrast enhancement. The PC compresses common bile duct, portal and inferior cava veins, violates the emptying of the stomach. In this case DPDS also include dilatation of the main pancreatic duct throughout and pancreatic tail PC (35 × 18 mm). In accordance with CECT data, high risk of rupture, percutaneous, transpapillary and transluminal drainage was associated with small success rate. A decision was made to create fully laparoscopic cystojejunostomy.
Features of surgery: The PC had been partially mobilized, a puncture with urgent cytological examination of the cystic fluid was performed. No data of malignancy was received. Was performed manual intracorporeal one-layer end-to-side interrupted anastomosis between PC and Roux-en-Y loop using Prolene 2/0.
Results: In early postoperative period all symptoms were resolved. The operation lasted 120 min, blood loss was 100 ml. The patient was discharged on the 12th day after surgery.
Hepato-biliairy & pancreas—pancreas
V212—Fully endoscopic transgastric treatment of a ‘walled-off’ necrosis
Sebastiano Spampatti1, M. Maffei, D. La regina1, M. Di Giuseppe1, F. Mongelli4, A. Cristaudi4, D. Bartolucci2, A. De Gottardi5, P. Majno-Hurst4, G. Lollo3, A. Fasoli3
P Ospedale Regionale di Bellinzonae Vall, 1Surgery, 2Radiology, 3Gastroenterology, Ospedale Regionale di Lugano, 4Surgery, 5Gastroenterology, Switzerland
Background: Necrotizing pancreatitis is a dramatic condition occurring in up to 20% of patients with acute pancreatitis. In some cases, a well-circumscribed area of necrosis can develop generally after four weeks from the initial attack: an entity known as the walled-off pancreatic necrosis (WOPN).
Over the last 10 years, the treatment of WOPNs changed from an open approach with surgical necrosectomy to a minimally invasive ‘step-up’ approach, consisting in a percutaneous or endoscopic transluminal drainage followed, if necessary, by minimally invasive necrosectomy. This approach allows a significant reduction in mortality, however complex and extended transgastric necrosectomies are require considerable expertise, motivation, and an established multidisciplinary team.
We aim to present the case of a successful completely endoscopic transgastric traetment of a walled-off necrosis.
Methods: A 68-year-old male with acute pancreatitis Balthazar E developed 4 weeks after onset of symptoms a 9,5 × 13 cm big pseudocyst, involving the head of the pancreas associated with a pancreatic duct rupture. The patient was symptomatic for gastric outlet obstruction and had persistent signs of infection. Serial CT and MRI scans were performed, showing the development of a WOPN during the course.
Results: The first step, was the endosonographic guided placement of a double pig-tail in the pseudocyst through a transgastric access. After the collection evolved into a walled-off structure, before starting with the second step, a profilactic embolization of the gastroduodenal artery was decided, because of its course through the necrotic tissue. Finally, necrosectomies could safely be performed, through the transgastric access with diathermic and mechanical debridement and with H2O2 lavage. Three consecutive procedures, during 2 weeks, where needed to obtain a complete removal of the necrotic tissue. Because of the Wirsung interruption, the double pig-tails were left in place. Follow-up CT scans at 1 and 6 month after the procedures, showed the absence of residual peripancreatic necrotic tissue and the patient recovered well, with complete relief of symptoms.
Conclusions: Endoscopic transgastric necrosectomy is a feasible and can represent a successful option in a step-up approach for acute necrotizing pancreatitis evolving in WOPN.
Hepato-biliairy & pancreas—pancreas
V213—Incidental eosinophilic pancreatitis after minimally invasive radical pancreaticoduodenectomy for suspected bile duct cancer
Gil Faria, J.P. Gonçalves, L. Freire, R. Peixoto, L. Barbosa
ULS Matosinhos/Hospital Pedro Hispano, Surgery, Portugal
Eosinophilic pancreatitis is a very rare form of chronic pancreatitis, with less than 100 cases described worldwide. It usually presents with obstructive jaundice and a mass simulating pancreatic or bile duct cancer. Patients might present peripheral eosinophilia and most reported cases are in young adults or children, thus increasing the suspicion of non-malignant disease. However, due to the difficult diagnosis and the risk of malignancy most patients end-up having surgery and the diagnosis is made on histological analysis.
We present the case of a 77 years-old female patient with prior history of multinodular goitre, high blood pressure and COPD. She presented in the ER, complaining of jaundice with 1-week evolution, preceded by a 2-months history of abdominal pain, fullness, vomiting and weight-loss. On admission she had obstructive jaundice with signs of infection (elevated CRP with high WBC count). The CT scan revealed a Curvoisier gallbladder, massive dilatation of the CBD and an intraluminal nodule of the terminal bile duct. Serum CA 19.9 was elevated, and CEA was normal. The patient was treated with IV antibiotics and proposed for laparoscopic pancreatoduodenectomy 2 weeks later.
During surgery, we noticed several enlarged lymph nodes and completed a radical peri-pancreatic lymphadenectomy. The post-operative period was uneventful.
The histological examination revealed a chronic pancreatitis with extensive eosinophilic infiltration of the pancreas and bile-duct. The 46 lymph nodes were reactive to inflammation and on retrospective analysis the patient had prior blood samples with eosinophilia (not present in the acute phase).
Conclusion: This is an extremely rare diagnosis, especially with advancing age but in order to avoid potentially unnecessary surgeries, we must increase our level of suspicion of this form of pancreatitis.
Hepato-biliairy & pancreas—pancreas
V214—Minimal access Retroperitoneal Pancreatic Necrosectomy (MARPN) in severe acute pancreatitis: carter´s technique
Fernando Burdio, P. Sanchez-Velazquez, B. Lelpo, B. Pueyo
Hospital Del Mar, Surgery, Spain
Introduction: Newer approaches of necrotising pancreatitis have focused on a combined “step-up” approach in which percutaneous drainage catheters are placed in infected collections, followed by minimally invasive debridements along the catheter tract if the patient fails to improve. In this setting one of the best technique is the video-assisted retroperitoneal debridement (VARD) in which the skin incision is progressed along the catheter track into the cavity to be drained by a retroperitoneal video-assisted access. One of the most fearing and cumbersome issue of these procedures is bleeding. An even less invasive procedure may be MARPN in which a 30F balloon-dilatation of the drain tract allows insertion of Amplatz dilators and sheaths. Afterwards, a nephroscope with a 5-mm working channel is usually employed to clean the residual cavity.
Methods: 41-year-old male patient suffering from a severe acute pancreatitis in a late phase (6 weeks of evolution) presented an infected walled-off necrosis -WON- (following the Atlanta Classification terminology) in the pancreatic and peripancreatic area. After two insufficient image-guided percutaneous drains, a VARD procedure was tried but it was interrupted before reaching the WON because persistent arterial bleeding which required tamponade likely because colateral circulation around WON. Seven days after that procedure, a MARPN was peformed along the same access.
Results: The MARPN procedure was succesfully performed under general anesthesia. Some 10 l of normal saline were employed and with grasper and a Dormia basket abundant fluffy cloud-like pus and loose necrotic material were obtained. A 30 F Nelaton drain along the track permitted subsequent cleaning during the PO.
Conclusions: The MARPN procedure could be an interesting alternative to VARD in some difficult cases.
Hepato-biliairy & pancreas—pancreas
V215—Laparoscopic enucleation of a non-functionning neuroendocrine pancreatic tumor
Pablo Rodriguez1, M. Alba2, D. Bejarano2, J. Candon2, P. Beltran2, R. Balongo1
Juan Ramon Jimenez Hospital, 1General Surgery, 2Hepatobiliary and Pancreatic Surgery, Spain
Objective: The indications for pancreatic enucleation, which consists in tumor excision without adjacent parenchymal resection, are increasing because benign solid or cystic tumors are growingly being detected earlier thanks to the spread of imaging tests. Pancreatic enucleation carries a significant risk of pancreatic fistula, but it is justified by the low recurrence rate and the excellent long-term functional results. Furthermore the fistulas after enucleation tend to be less severe than after traditional resection.
The enucleation is considered in neuroendocrine tumors if signs of benignity: tumor well limited, insulinoma (benign in 90% of cases), non-functioning tumor (with a size < 2-3 cm), well-differentiated (mitotic index < 2% and Ki67 < 3%), no endovascular or perineural invasion, no lymph node or visceral metastasis (ruled out by endoscopic ultrasound and octreotide scan). It should be contraindicated in the presence of MEN 1 syndrome, gastrinoma, and/or when malignancy is suspected. Last but not least the tumor must not be in contact with the Wirsung’s duct (considering a distance > 1 mm as safe for enucleation). Laparoscopic approach for the pancreatic surgery has been increasingly reported, specially for benign pancreatic pathologies, due to its feasibility, safety and quicker recovery.
We report a case of enucleation of a nonfunctioning neuroendocrine tumor located at the body of the pancreas, in a 46 year-old woman with Lynch syndrome.
Methods: A 2,5 cm tumor at the pancreatic body is identified by CT scan (image 1). The patient refers no symptoms. Endoscopic ultrasound of the pancreas locates as well the tumor, peripheral and separated to the Wirsung duct. A sample tissue reveals a grade 2 nonfunctioning neuroendocrine tumor, expressing a ki67 3% index.
Results: Laparoscopic enucleation is successfully performed (image 2) due to its benignity, size and favorable location. The patient develops a biochemical leak, being discharged home with the drain five days later. Drain is removed at the first review at surgery in the following week. A well-differentiated or low grade tumor (G1) is confirmed on histology.
Conclusion: Laparoscopic enucleation of neuroendocrine tumors at the pancreatic body is feasible, safe and not detrimental to long-term survival when it meets criteria.

Hepato-biliairy & pancreas—pancreas
V216—Laparoscopic spleen preserving distal pancreatectomy by Kimura: first step to continue specializing in laparoscopic of the Pancreas
Rocío Pérez Quintero, M. Alba Valmorisco, J. Candón Vázquez, D. Bejarano González-Serna, R. Balongo García
Hospital Juan Ramón Jiménez, General Surgery, Spain
Aim: Laparoscopic distal pancreatectomy (LDP) has advantages over its open counterpart. Given the location of the retroperitoneum, the special physiology of the endocrine and exocrine of the pancreas, close relation with major vessels, and long learning curve, laparoscopic pancreatic surgery is more difficult to perform than surgeries for other abdominal organs. Two surgical techniques for spleen preserving distal pancreatectomy (SPDP) have been described by Kimura and Warshaw.
Methods: We present the case of a 66 years-old woman with no relevant medical history admitted and treated in hospital for mild acute biliary pancreatitis. During the study she was diagnosed with 12 × 15x14 mm tumor on the body of the pancreas compatible with low-grade neuroendocrine tumor (NET) that shares semiology with Intraductal papillary mucinous tumor (IPMT) and cholelithiasis by CT scan. Endoscopic ultrasonography (EU) suggests it is a IPMT. Biopsy is performed. Histology report a single sparsely cellular group, staining for neuroendrocrine markers but which is not representative. Magnetic resonance don’t show relevant data and Octreoscan findings consistent with a neuroendocrine tumor expressing somatostatin receptors.
Results: We decided to perform a laparoscopic spleen preserving distal pancreatectomy with splenic vessels preservation (LSPDP-SVP) plus cholecistectomy. For LSPDP-SVP the difficulty is related with the splenic vessels dissection and manipulation. Surgery and post-operative were uneventful and she was discharged on the 5th post-operative day. The histological report revealed a pancreatic Neuro-endocrine tumor free margins, G1, pT1 and Cholelitiasis.
Conclusions: LDP can be considered the technique of choice in the treatment of primary benign pancreatic lesions and an alternative to the open approach in selected patients diagnosed with malignant pancreatic lesions. Higher morbidity and late complications are associated when the spleen is preserved without preserving the splenic vessels (Warshaw technique).
As surgeons' experience with advanced laparoscopic and robotic skills has been growing around the world, new innovations and breakthrough in minimally invasive pancreatic procedures will evolve.

Hepato-biliairy & pancreas—pancreas
V217—Distal pancreatectomy with spleen-preserving techniques
Vadym Ilyashenko, Volodymyr Grubnik, V. Grubnyk
Odessa national medical university, Surgery, Ukraine
An estimated incidence Pancreatic neuroendocrine tumors (PNETs) in Ukraine about 10 cases per 1 million people each year. Patients with PNETs may present with symptoms that result from secretion of active gastrointestinal hormones and local symptoms from tumor growth. In the absence of metastatic disease, the primary treatment of PNETs is surgical resection. Knowledge of lymph node status allows for a better determination of prognosis, although there is no proven therapeutic value to lymph node removal. Similarly, the importance of splenectomy with distal pancreatectomy is controversial because spleen-preserving techniques have lower lymph node yields. We present two cases of patients with insulinoma pancreas tail. We performed distal pancreatectomy with spleen-reserving technique. Both patients had severe concomitant diseases, ASA III. In this regard, the level of carbon dioxide in the abdominal cavity didn’t exceed 10 mm Hg throughout the operation.
The mean operation time was 90 min. The blood lost was 20 -30 ml. The first patient, in the postoperative period had left-sided pleurisy in a volume of not more than 100 ml. And increase in blood platelet count to 900,109/was observed. Normalisation of blood counts came a month later. Blood glucose levels normalised immediately after surgery in both cases and remained at the level of 4.2—5.6 mmol/l during the entire observation of patients. In the postoperative period, low molecular weight heparins were used to prevent thromboembolism. In both cases POD = 7.
Hepato-biliairy & pancreas—pancreas
V218—Totally laparoscopic treatment of DPDS (disconnected pancreatic duct syndrome) in patient with giant pancreatic head pseudocyst
Alexander Voynovskiy, E Belykh, D Mudryak, M Tokarev
I.M. Sechenov First Moscow State Medical University, Abdominal, Russia
Introduction: DPDS is one of the frequently overlooked complications of acute pancreatitis. That’s why it’s an open and actual problem. Currently, it is not fully known which is preferable: early surgical intervention or step up approach.
Aims: To show an effective method for treating giant pancreatic head pseudocyst when minimal invasive approach is inefficient.
Methods: Male born in 1984 with giant pancreatic head pseudocyst (PC). In anamnesis: some cases of acute pancreatitis with conservative treatment. Real exacerbation started with jaundice, growing up nausea and vomiting. On CECT there is a pancreatic head pseudocyst 100 × 155 mm which is heterogeneous due to septums and big soft tissue inclusion (26 cm3) without contrast enhancement. The PC compresses common bile duct, portal and inferior cava veins, violates the emptying of the stomach. In this case DPDS also include dilatation of the main pancreatic duct throughout and pancreatic tail PC (35 × 18 mm). In accordance with CECT data, high risk of rupture, percutaneous, transpapillary and transluminal drainage was associated with small success rate. A decision was made to create fully laparoscopic cystojejunostomy.
Features of surgery: The PC had been partially mobilized, a puncture with urgent cytological examination of the cystic fluid was performed. No data of malignancy was received. Was performed manual intracorporeal one-layer end-to-side interrupted anastomosis between PC and Roux-en-Y loop using Prolene 2/0.
Results: In early postoperative period all symptoms were resolved. The operation lasted 120 min, blood loss was 100 ml. The patient was discharged on the 12th day after surgery.
Conclusion: laparoscopic cystojejunostomy is an effective minimal invasive and low traumatic technique. It can be used for treatment pancreatic PC and walled of necrosis (WON) when they contain septated fluid cavities with big soft tissue component.
Hernia-adhesions—abdominal wall hernia
V013—Minimally invasive approach to lateral ventral hernia: a case series
Sajid Malik, D. Lomanto
National University Hospital Singapore, Minimally Invasive Surgery, Singapore
Introduction: Lateral ventral hernia is rare and can be primary or incisional. Surgical treatment of this rare hernia is challenging due the anatomic location and technical challenges in placement and secure anchoring of mesh.
Aim: Method: We report our experience on 15 lateral ventral hernias. 6 of them were incisional hernia (2 after previous open appendicectomy, 2 port-site hernia, 1 from the lateral edge of pfannenstiel incision and 1 from previous iliac bone harvest for reconstruction) and 9 primary hernias (8 Spigelian and 1 the defect was lateral to the semilunar line).
Results: All patients underwent hernia repair with mesh with various minimally invasive approaches and the fascial defect was closed with non-absorbable sutures in all cases. 4 underwent repair with extended totally extra-peritoneal (eTEP) approach, 5 had (intra-peritoneal on-lay mesh, plus) IPOM + technique, 3 had (trans-abdominal pre-peritoneal) TAPP approach, 1 had IPOM + with limited conversion technique, 1 had Robotic retro-muscular repair and 1 of the port-site hernia was repaired with a small 3 cm open incision using a new composite mesh “hernia patch”. All patients recovered well with no significant morbidity. 2 patients had seroma, which were managed conservatively. None of the patients had any recurrence or chronic pain up to follow-up of 6 months.
Conclusion: Lateral ventral hernia is rare and the repair is technically challenging. This case series gives a broad outline of possible minimally invasive surgical options available for this rare condition. The surgical technique needs to be individualized according to the size, anatomic location of the defect, other intra-operative findings and patient characteristics.
Keywords: Ventral, Hernia, Laparoscopy, Mesh.
Hernia-adhesions—abdominal wall hernia
V014—ICG and new meshes to reduce complications. Mis Suprapubic Subcutaneous Approach in Diastasis Recti with Primary Midline Ventral Hernia associated
Eugenio Licardie1, J. Bellido-Luque2, I. Cornejo-Jurado2, M. Sánchez-Ramirez2, A. Tejada-Gómez1, A. Bellido-Luque1
1Quironsalud Sagrado Corazón, Department of General and Digestive Surgery, 2University Hospital Virgen Macarena, Seville, Unit of General and Digestive Surgery, Spain
Aims: Patients with umbilical or epigastric hernias with associated diastasis recti may benefit from minimally invasive interventions. However, the ideal technique is still under debate. It represents an aesthetic and symptomatic issue. The pre-fascial endoscopic approach could solve the midline defect with placement of a pre-aponeurotic reinforcement prosthesis, increasing the safety of the repair, without going into the abdominal cavity and providing good results.
The main indications for a minimally invasive approach are primary midline ventral or incisional hernia associated with diastasis recti, and absence of excessive fat or skin. The disadvantages may be the hypo-vascularisation of the dermo-fatty flap and the increase in post-operative seroma, where we consider that the ICG and self-adhesive meshes may be a key factor.
Methods: 47-year-old woman, presents umbilical hernia of 2 cm, epigastric hernia of 3 cm and diastasis recti of 3 cm. Umbilical hernioplasty + supraumbilical hernioplasty + repair of diastasis recti with endoscopically both anterior rectus sheaths plication and onlay mesh placement.
Results: Trocars are placed in suprapubic position 1 × 12 mm (medial) + 2 × 5 mm (both sides). With CO2 pressure at 8 mmHg, the supra-aponeurotic tunnel is created up to the sub-xiphoid region, dissecting with cautery, releasing the umbilical hernia and reducing it, releasing the supra-umbilical hernia and proceeding to the plication of both anterior rectus sheaths with non-absorbable barbed suture. Placement of self-fixing mesh ‘Adhesix ™’ of 25 × 9 cms. Reinsertion of the umbilicus. Closed drainage. Discharge the following day with drainage, which is removed 4 days after. Follow-up without complications or data on recurrence.
Conclusions: In minimally invasive approaches, such as the one we have presented, one of the main limitations is the extensive subcutaneous dissection carried out to adequately place the mesh in the onlay position, which can produce signs of hypovascularisation of the dermo-fatty flap and a significant increase in the post-operative seroma. With the new assessment techniques using ICG fluorescence angiography, these complications associated with inadequate blood supply are avoided and the use of self-fixing meshes reduces the dead space and the occurrence of post-operative seroma.
Hernia-adhesions—abdominal wall hernia
V015—Robot Assisted Totally Extraperitoneal Retrorectus Repair (ETEP) for umbilical hernia and postpartum rectus diastasis: a technical report
Ann-Sophie Hufkens, F Muysoms
Maria Middelares Hospital, General and abdominal surgery, Belgium
Aims: We present a case of a 36-year-old female with periumbilical pain and a ‘bulge’ at the midline after two pregnancies and a laparoscopic procedure for an ovarian cyst. Clinical examination confirmed a diastasis recti of 3 fingers (maximum 5 cm) in width with a small umbilical trocar hernia. No further investigations were performed.
Methods: This video presents a stepwise approach of the robot assisted extraperitoneal retrorectus repair (eTEP) of ventral hernias with diastasis by suprapubic docking. A 5 mm skin incision was made at the umbilicus and a 5 mm scope was inserted through the anterior rectus fascia, parallel to the muscle fibers and superficial to the posterior rectus sheath. Insufflation of CO2 and blunt dissection with the camera was performed to develop the preperitoneal space of Retzius. Lateral dissection towards Bogros space, lateral of the inferior epigastric vessels. Three 8 mm trocars were placed at the bikini line. Suprapubic docking of the robot. Cranial retrorectus dissection incising the posterior rectus fascia medially on both sides, whilst keeping the peritoneum intact on the midline. Dissection of the retrorectus plane up to the xiphoid process was carried out and hernia contents were reduced. The linea alba was reconstructed together with closure of the umbilical hernia defect with a running suture V-Loc 2/0. A parietex progrip mesh was cut (10 × 27 cm) and placed assuring complete coverage of the space and good overlap of the hernia defect. No mesh fixation was used.
Results: The patient experienced an uncomplicated postoperative course. She was discharged on the same day of surgery.
Conclusion: This video illustrates a novel suprapubic approach for robot assisted repair of ventral hernias with diastasis. It allows a wide dissection and retrorectus mesh reinforcement with minimal scarring and can most often be performed as a day case.
Hernia-adhesions—abdominal wall hernia
V016—Lira-Tape technique for AWR in Suprapubic Hernias Associated to Midline Medium-Size Hernia
Julio Gómez-Menchero, P. de la Herranz, A. Gila Bohorquez, J. Garcia-Moreno, J.M. Suarez-Grau, S. Morales-Conde1
Hospital de Riotinto, Surgery, 1Hospital Universitario Virgen del Rocio, Spain
Background: LIRA technique (Laparoscopic Intracorporeal Rectus Aponeuroplasty) was described in 2018 in order to reduce the tension in the midline as an alternative for Closing the defect (CD) during Laparoscopic Ventral Hernia Repair. TAPE Technique (Transabdominal Partial Extraperitoneal) was described in 2011 in order to repair complex suprapubic hernias in order to reduce the recurrence rate. We present the Minimal invasive Abdominal Wall Reconstruction (AWR) in a case of suprapubic hernia associated to a medium-size midline hernia using LIRA technique combined with the TAPE technique.
Methods: A 50 years old obese (BMI 41%) female is affected with a large suprapubic incarcerated hernia secondary to an elective cesarean associated to a midline hernia M2-3 W2.
A preoperative Computerized Tomography showed an over 6 cms width suprapubic hernia defect associated to a M2-3 W2 defect following the EHS Classification. A minimally invasive procedure was selected for restoring the midline by laparoscopic approach.
Results: Patient was positioned in decubitus supine. 3 Ports (2 of 5 mm and 1 of 12 mm) were positioned following the left mid axillary line for LIRA technique and another supraumbilical (10 mm) and right paraumbilical (5 mm) were placed to assist the TAPE procedure. The content of the sac of the suprapubic hernia was removed into the abdominal cavity and the sac was partially removed. A peritoneal flap is created in order to expose de pubic arch and the Cooper´s Ligament bilaterally. A Defect Closure (DC) was performed in suprapubic defect using a barbed suture. For LIRA technique the posterior rectus sheath was opened lengthwise around the hernia defect to create two flaps and was then sutured. The size of the flaps was estimated using a mathematical formula as in LIRA technique is described. An intraabdominal mesh as a reinforcement of the Aponeuroplasty is performed using an intraperitoneal mesh (Polyvinylidene fluoride (PVDF) mesh, Dynamesh (®)-IPOM (FEG Textiltechnik mbH, Aachen, Germany. The mesh size overlapped the suprapubic arch and was fixed using helicoidal sutures and extended to midline completely covering the area where the fascia was dissected to perform the aponeuroplasty, including the whole incision in this case that was an incisional hernia. Pelvic peritoneum flap was used to cover partially the mesh. A drainage was placed into the abdominal cavity. Patient was discharge without complications in 72 h.
Conclusion: Complex hernias close to bones, as suprapubic hernias, can be restored using a minimal invasive surgery even in those cases associated to mid-line medium or large hernias. The LIRA technique in our experience could be associated to others transabdominal procedures as TAPE with a low rate of postoperative complication with no recurrence and a low rate of bulging being a safe, feasible and reproducible technique.
Hernia-adhesions—abdominal wall hernia
V017—Robot-assisted laparoscopic bilateral transversus abdomnis release (TAR) technique repair for an incisional hernia: Tricks & tips
Rafael Villalobos, Y. Maestre, G. Protti, C. Mias, J.J. Olsina
Arnau de Vilanova University Hospital, General Surgery, Spain
Incisional hernia repair has evolved in the last 20 years. The open approach was moved by the laparoscopic tecniques because of the spread of minimally invasive surgery. Nevertheless some kind of incisional hernias have been repaired with an open approach because of their complexity. The robot-assisted laparoscopic approach emerged as a useful tool in some of these situations. The posterior component separation, the suture of the defect, the disection of the preperitoneal space are very difficult in a laparoscopic approach because of the limited movements of the instruments. The robotic assistance "jumped" all of these limitations allowing the surgeons to performe maneauvers that they cannot imagine before. But, in spite of its utility, we need to understand that there are very complex incisional hernias that should be repaired by an open approach and that decision will be at the discretion of the surgeon.
Our group began with the robot surgery in 2019 and after one year, we gained experience performing bilateral transversus abdominis release (TAR) technique. This experience allowed us to improve our technique and to develop step by step how to do it better.
We present a video developping a step by step bilateral TAR showing the tricks and tips that allow you to do it as well as possible.
Hernia-adhesions—abdominal wall hernia
V018—Laparoscopic intraperitoneal onlay mesh (IPOM) plus repair using articulating needle holders
So Kang, S.J. Kwon, S.J. Lee, Y.S. Park, S.H. Ahn, Y.S. Suh, H.H. Kim
Seoul National University Bundang Hospital, Surgery, Korea
Laparoscopic intraperitoneal onlay mesh (IPOM) repair is an effective way to treat ventral hernias including incisional hernia. IPOM plus, which includes primary closure of the defect, is even more effective, but hand-sewn suturing may be technically demanding depending on the location of the fascia defect. A 65-year old male with a periumbilical incisional hernia after robotic radical cystectomy was admitted for laparoscopic repair. This video illustrates how new laparoscopic devices such as articulating needle holders can be used to facilitate the laparoscopic IPOM plus procedure.
Hernia-adhesions—abdominal wall hernia
V219—Robotic repair of symptomatic Spigelian hernia: Advantages of minimaly invasive robot-assited surgery
Alejandro David Bueno-Cañones, M. Toledano-Trincado, J.I Blanco-Alvarez, E. Choolani-Bhojwani, F. Acebes-Garcia, P. Marcos-Santos, S. Veleda-Belanche, F.J. Tejero-Pintor, A .Centeno-Velasco, K. Plua-Muñiz, C. Tinoco-Carrasco, R Otero-Roussel, J.M Garcia-Abril-Alonso, M.L. Martin-Esteban, D. Pacheco-Sanchez
Hospital Universitario del Río Hortega, Cirugía General y del Aparato Digestivo, Spain
Aims: Show how technical difficulties when performing certain surgical gestures with the robotic platform are reduced during the hernia repair.
Methods: A 74 years-old woman with a medical history of hypothyroidism, hypertension and without prior surgical procedures. Reffered to the consultation for discomfort associated with Spigelian hernia. On examination, the patient presented a Spigelian right hernia with 5 cm in diameter, which associated adhering solid mass. Robotic hernia repair with mass resection, was proposed, which the patient accepted with prior informed consent.
Results: The procedure was carried out entirely with a robotic platform. The surgical time was a total of 270 min. The use of robot-assisted minimally invasive surgery improved the efficiency of the dissection phase, suture and the ergonomics for the surgeon. The mesh was placed in a retromuscular position, performing right transversus abdominis release. There were no intra- or postoperative complications, and the patient was discharged after 24 h.
Conclusion: Spigelian hernias are a rare defect, with a high risk for incarceration or strangulation. Hernia repair can be performed with open or minimally invasive techniques. Robotic Spigelian repairs have been rarely reported in the literature. The robotic approach allows suturing and dissect with more precision and comfort.
Hernia-adhesions—abdominal wall hernia
V220—Robotic pauli technique: a minimally invasive alternative for the repair of parastomal hernias
Gian Pier Protti Ruiz, Rafael Villalobos, R. Villalobos, Y. Maestre, M.C. Mias, J.J. Olsina
Arnau de Vilanova Hospital, General Surgery, Spain
Aims: A parastomal hernia is the most common complication after the creation of a colostomy, occurring in 50% of patients. Several techniques have been described to repair these defects, with varying results. Pauli described a modification to the known Sugarbaker technique, but placing the mesh in the retromuscular and preperitoneal space, thus maintaining the abdominal wall biomechanics. With the emergence of minimally invasive, robot-assisted surgery, some of these procedures have been adapted to this modality.
Methods: We hereby present a video explaining how we performed a robotic Pauli technique repair of a parastomal hernia.
Results: We operated a 66 year-old female patient with a previous Miles procedure due to a rectal adenocarcinoma. She had undergone an onlay mid-line hernioplasty and a parastomal herniorrhaphy. She had a type IV parastomal hernia recurrence with an associated M2W2 incisional hernia, according to the European Hernia Society classification. We placed 3 lateral right trocars, dissected the left posterior rectal sheath and performed a left transversus abdominis release. We closed the defects using barbed absorbable sutures as well as the mid-line. We placed an Adhesix 25 cm by 25 cm mesh, according to the Pauli technique, in the retromuscular, preperitoneal left space.
Conclusions: The patient was discharged after 2 days. There were no complications detected neither during hospital-stay nor in the 1 month follow-up.
The robotic Pauli method is feasible. With time we’ll determine if the results are as good as the ones described with the open technique.
Hernia-adhesions—abdominal wall hernia
V221—Parastomal hernia reparir by laparoscopic sugarbaker technique
José Antonio Becerra1, Perez2, Martinez3, Balongo2
Juan Ramon Jimenez Hospital, 1Wall unit, 2General surgery, 3Coloproctology, Spain
Aims: Creating an intestinal stoma is commonly uses by surgeons for different reasons and can produce complications, being the parastomal hernia one of them. This is not surprising given the fact that the stoma is essentially a hernia. The incidence ranges between 30–50% in the next two years after its performance. Many parastomal hernias are asymptomatic, but may produce problems ranging from mild parastomal discomfort to life-threatening complications such as strangulation, perforation and obstruction.
Surgical intervention is the only therapeutic option for its repair. Several techniques have been described for this, from the Keyhole by Rosin and Bonardi in 1977, through the Sugarbaker technique in 1985 to its modification for later laparoscopic performance, as well as the repositioning of the stoma.
Laparoscopic repair of a parastomal hernia with a modified Sugarbaker technique is the laparoscopic repair of the stomal hernia with a nonslit mesh covering the hernia defect with at least a 5-cm overlap; with lateralization of the colon/ileum going into the stoma, that treatment has been shown to have the lowest rates of recurrence. It should be performed by specialized wall surgery surgeons with laparoscopic skill and experience.
Methods: We present the case of a 75-year-old woman with Crohn's disease of rectal and perianal involvement with poor control of the disease and who undergoes surgery by performing a Hartamnn urgently, without desires of reconstructive surgery.
She came to the hospital with a parastomal hernia developed lateral to the stoma that causes discomfort and limits her quality of life. Computed tomography (CT) revealed a parastomal hernia.
Results: We decided to perform a laparoscopic surgery based on modified Sugarbaker technique. Two 10-mm trocar and one 5-mm trocars were placed with a 10-mm/30° video- scope introduced anteriorly. This process allowed clear visualization and inspection of abdominal contents, in particular, where the adhesiolysis needed to be performed. The most difficult part of any laparoscopic parastomal hernia repair is the safe division of adhesions, and extreme care must taken to avoid electrocautery. After this, the content of the hernial sac can be reduced and a partial closure of the hernial ring should be done. The hernial defect is measured to calculate the size of the mesh. We used a microporous ePTFE mesh and tackers to fix it.
Her postoperative recovery was uneventful and the patient was discharged on postoperative day 2. Follow-up in the first and third postoperative months without hernia recurrence.
Conclusions: Laparoscopic parastomal hernia repair with modified Sugarbaker technique has become increasingly the operation of choice because of its low recurrence rates. This technique is safe and offers minimal postoperative morbidity and rapid surgical recovery.
Hernia-adhesions—abdominal wall hernia
V222—Advantages of totally Endoscopic Retromuscular Approach (eTEP) with Transversus Abdominis Release (TAR) in Mcburney recurrent incisional hernia
Eugenio Licardie1, A. Bellido-Luque1, I. Cornejo-Jurado2, M. Sánchez-Ramirez2, A. Tejada-Gómez1, J. Bellido-Luque2
1Quironsalud Sagrado Corazón, Department of General and Digestive Surgery, Seville, 2University Hospital Virgen Macarena, Seville, Unit of General and Digestive Surgery, Spain
Aims: The eTEP technique includes surgical approach and strategies designed to enhance an extraperitoneal working space regarding minimally invasive of ventral and incisional hernias and the performance of other surgical procedures. These procedures include remote access, the creation of a large extraperitoneal space and the flexible position of the working trocars; complemented by the excision of the natural limits of the space. The eTEP technique makes it possible to use the advantages of extraperitoneal surgery by reducing adhesions, avoiding bowel injury and intra-abdominal meshes. eTEP-TAR is performed in midline incisional hernias > 9 cm size and non-midline hernias lateral to semilunar line.
Methods: 40-year-old man with recurrent incisional hernia L3-W2, secondary to Mc Burney, who underwent two years ago to laparoscopic IPOM + technique due to a hernia recurrence. A new lateral multirecurrence incisional hernias was developed, and eTEP-TAR procedure was indicated.
Results: Incision is made in the left hypochondrium and dissection of the retromuscular space is performed with the 'balloon' trocar. Introduction of 11 mm and 2 × 5 mm trocars in the left lateral flank. Opening of the medial aspect of the left posterior medial rectus sheaths, supraumbilical crossover and creation of the right retromuscular space. Reduction along of the hernia sac is carried out, observing previous intra-abdominal mesh. Identification of the transverse muscle on the right side, which is released along its entire length from up to down. Closure of the defect with a non-absorbable barbed suture (V Loc 1). Closure of the peritoneal sac. Symbotex composite mesh ™ measuring 20 × 30 cm is placed, without any fixation. Placement of drainage. Discharge without complications on the fourth post-operative day. Follow-up after six months with no data on recurrence or chronic pain.
Conclusions: We consider that treatment by eTEP for a recurrent incisional hernia secondary to McBurney is a good indication as it has the advantages related to an extraperitoneal approach. In the case of a recurrence with previous intraperitoneal mesh placement, even if it has some hole in the peritoneum, it is not necessary to close it, since it is reinforced by the previous intra-abdominal mesh. Another advantage of the eTEP approach is that it can be combined with other techniques, as in this case with the right TAR.
Hernia-adhesions—abdominal wall hernia
V223—Giant spiegel hernia—3D planning and minimally invasive treatment
Rafael Diaz Del Gobbo, N. Guardia, R. Sanchez, R. Farre, M. Guell, C. Guariglia, A. Osorio, L. Sanchon, S. Pardo, M. Sola, E. Soto, T. Lobez, P. Collera
Althaia Sant Joan De Deu, General Surgery, Spain
Objective: Demonstrate the advantages of planning with 3d technology in complex cases of the abdominal wall and technical tricks for the repair of giant spiegel hernia.
Methods: 71-year-old patient, obese, BMI 38, asthmatic, hypertensive. with a history of a long-lasting flank mass, for which he attended a consultation where a giant spiegel hernia was studied and diagnosed, with significant migration of the omentum and colon to the hernial cavity. after comprehensive assessment. and symptoms, pain, discomfort, it was decided to perform minimally invasive surgical treatment.
Results: A 3D model of the abdominal CT is performed, and it is possible to assess the size of the hernia defect, calculate the volumes of the hernial sac that reaches from the rib to the iliac spine, and its relationship with the abdominal cavity, the relationships are calculated and the Possibility of compartment syndrome, and the size of the hernial ring, it is anticipated that closure of the defect is possible. A preperitoneal Transabdominal abortion (TAPP) is performed, the surgery begins, with the meticulous reduction, of the herniated content, almost the entirety of the omentum and transverse and descending colon, this is an important point, very delicate where injuries should be avoided by traction of the colon, after carefully reducing all the contents, careful hemostasis of the omentum is performed. and a hernial defect is assessed, it coincides with the assessment of the 3D model, and the peritoneum of the sac is reduced, taking advantage of as much peritoneum as possible, to facilitate closure later. The entire peritoneum of the left iliac fossa is dissected en bloc, the spiegel ring and the inguinal region, tension-free closure of the defect is performed with 2 continuous V-LOOK 2.0, and subsequent placement of 15 × 15 cm polypropylene mesh en block and posterior closure of the peritoneum covering the entire mesh. and the redundant peritoneum is resected. The patient presented a postoperative period, without incident and was discharged the same day in the afternoon.
Conclusion: The 3D model allows us to assess the actual abdominal and hernia volumes of the patient and to simulate the findings in surgery, the benefits of these planning are yet to be developed.
The laparoscopic preperitoneal repair is an excellent approach for spiegel's hernia.
Complex cases are also candidates for outpatient surgery.
Hernia-adhesions—abdominal wall hernia
V224—Laparoscopic transiliac hernia repair following iliac crest harvest
Jacobo Trébol, J.M. Sánchez-Tocino, L. Muñoz-Bellvís
Complejo Asistencial Universitario de Salamanca, General and Digestive Tract Surgery, Spain
Aims: Bone autografts from iliac crest or bone are frequently used in revision arthroplasty and to treat non-union. Potential complications include abdominal contents herniation with an incidence not well known but reported between 5–9%. The risk of incarceration is estimated 25% and of strangulation 10%.
The repair of these hernias is challenging due to the weakness of the regional soft tissues and bone rigidity. Options include isolated bone reconstruction, isolated abdominal wall reconstruction with meshes and simultaneous bone and abdominal wall reconstruction. Laparoscopic repair with prosthesis allows for employing big meshes, and is feasible, safe and offers the minimally invasive surgery advantages.
We present a patient managed successfully with a laparoscopic transabdominal pre and retroperitoneal prosthetic repair.
Methods: A 72-year-old female (BMI 30.05) with arterial hypertension, type 2 diabetes mellitus, bronchiectasis and hypothyroidism needed iliac crest harvesting for revision elbow arthroplasty two years ago. She presented complaining about an intermittent and growing painful mass over iliac crest, in the harvesting area. Bone and abdominal wall defect (4 × 5 cm) were observed in the anterior iliac crest on physical examination and confirmed on CT scan.
A four-port laparoscopic approach was performed on right lateral decubitus. A peritoneal flap over 5 cm beyond the anterior defect border was created and the muscular wall was exposed up to the defect. Hernia sac was reduced, and the dissection continued until psoas tendon exposure and at least 5 cm all around the defect. 15 × 15 cm medium-weight polypropylene mesh with 5 cm overlap all around, was fixed with double crown titanium tackers (avoiding posterior aspect), sutures in posterior part and with vaporized fibrin glue. Peritoneal flap was closed with running sutures. Procedure lasted 105 min.
Results: In hospital stay lasted 5 days due to refractory constipation and moderate pain. One month later patient presented with superficial and deep oligosymptomatic seroma managed conservatively. During the follow-up there was no recurrence.
Conclusions: Transiliac hernias are uncommon, difficult to manage and are associated with potentially severe complications. Laparoscopic approach is feasible and safe and allows employing big overlapping meshes. Employed without bone reconstruction, laparoscopy seems to be a good option for small to medium defects.
Hernia-adhesions—abdominal wall hernia
V225—Ole-Tapp-lira. Is it possible? how to do it!
Rafael Diaz Del Gobbo1, R .Sanchez, L. Sanchon, A .Osorio, C. Guariglia, S. Pardo, R. Farre, M. Guell, P. Collera
Althaia Sant Joan De Deu, General Surgery, 1Abdominal Wall Surgery, Spain
Objectives: To illustrate that a correct surgical planning allows to perform serveral endoscopic procedures, in a single surgical act, safely, without adding morbidity or complications.
Methods: 60-year-old patient, hypertensive. History of laparoscopic resection of the splenic flexure 2 years ago. Referred to the outpatient clinic for symptomatic cholelithiasis. in physical evaluation. Midline eventration (assisted incision in the splenic flexure resection), and left inguinal hernia were diagnosed. Being a patient in good general condition, active, no recurrence of neoplasia, we propose simultaneous minimally invasive treatment, cholecystectomy, transabdominal Preperitoneal hernioplasty (TAPP) and laparoscopic intra-abdominal rectal aponeuroplasty (LIRA) for midline eventration, in 1 surgical time.
Results: The surgery begins with planning the order of the surgeries and the location of the 4 trocars that allow the 3 surgeries to be performed in the most ergonomic way possible. It begins by performing the laparoscopic cholecystectomy, anti-trendelenburg position, with the surgeon on the left side of the patient and moving the 11 mm. optic trocar out of the midline to the right side of the patient, 2 trocars of 5 mm. for work, 1 trocar of 5 mm for the assistant, Once the cholescitectomy is finished, the position of the surgeon is changed to the right side of the patient and trendelemburg position to perform the repair of the left inguinal hernia EHS L1M0FO, inguinoscrotal, by TAPP technique, using a 15 × 15 cm polypropylene mesh, without fixation and closure of the peritoneum with continuous polydioxanone 2.0 suture. Finally, the surgery is completed by repairing the eventration of the midline M2M3W2 Length 10 cm, with the LIRA technique. changing the optics for a 5 mm. to the right 5 mm trocar, allows a better visualization of the midline, and using the 11 mm trocar, for the introduction of the Symbotex mesh, after performing aponeuroplasty,the midline is closed with 2 continuous barbed sutures 2.0, and the mesh is fixed with absorbable tackers, no drainage was used, it was not necessary to place additional trocar, the surgery lasted a total of 3 h, the patient had a postoperative period without incidents, and was discharged after 24 h.
Conclusion:
-Patients should be comprehensively evaluated to avoid missing concomitant pathologies.
-Advances in endoscopic abdominal wall repair techniques allow us to offer patients a global simultaneous minimally invasive treatment of various pathologies, with the benefit of avoid several surgeries.
-To our knowledge, this is the first time that these procedures have been performed simultaneously on 1 patient.
Hernia-adhesions—abdominal wall hernia
V261—Transversus abdominis release (TAR): advantages of minimaly invasive robot-assited surgery
Alejandro David Bueno-Cañones, A.D. Bueno-Cañones, M. Toledano-Trincado, J.I. Blanco-Álvarez, E. Choolani-Bhojwani, F. Acebes-García, S. Veleda-Belanche, F.J. Tejero-Pintor, A. Centeno-Velasco, K. Plua-Muñiz, C. Tinoco-Carrasco, R. Otero-Roussel, J.M. Garcia-Abril-Alonso, M.L. Martin-Esteban, D. Pacheco-Sanchez
Hospital Universitario del Río Hortega, Cirugía General y del Aparato Digestivo, Spain
Aims: Show how technical difficulties when performing certain surgical gestures with the robotic platform are reduced during the hernia repair.
Methods: A 85 years-old woman with a medical history of asthma, hypertension, dyslipidemia and mild aortic stenosis. Laparoscopic cholecystectomy was performed, with subsequent development of an umbilical hernia. Hernia repair was performed with onlay polypropylene mesh in 2016. The patient subsequently developed a chronic infection of the mesh that required surgical removal in 2019, producing the hernia recurrence. On examination, the patient presented a ventral umbilical hernia, with 10 cm in diameter. Robotic TAR was proposed, which the patient accepted with prior informed consent.
Results: The procedure was carried out entirely with a robotic platform. The surgical time was a total of 250 min. The use of robot-assisted minimally invasive surgery improved the efficiency of the dissection phase, suture and the ergonomics for the surgeon. The mesh was placed in a retromuscular position. There were no intra- or postoperative complications and the patient was discharged after 48 h.
Conclusion: Robotic TAR technique is reproductible and safe. It avoids the placement of a retromuscular mesh, reduces wound complications and the postoperative pain. In addition, the robotic approach allows suturing with more precision and comfort in comparison to conventional laparoscopy. It is probable that in the next years, with an increased availability of robotic platforms and with more surgeons trained and experienced in their utilization, a greater number of hernia repairs will be made using a minimally invasive approach assisted by robot.
Hernia-adhesions—abdominal wall hernia
V262—Advantages of minimaly invasive robot-assited abdominal wall surgery: Robotic transabdominal retromuscular umbilical prosthetic hernia repair (TARUP)
Alejandro David Bueno-Cañones,, M. Toledano-Trincado, J.I. Blanco-Álvarez, E. Choolani-Bhojwani, F. Acebes-García, P. Marcos-Santos, S. Veleda-Belanche, F.J. Tejero-Pintor, A Centeno-Velasco, K.T. Plúa-Muñiz, C. Tinoco-Carrasco, R Otero-Roussel, J.M. García-Abril-Alonso, C. Cuesta-Benavides, C. Benito-Fernández, D. Pacheco-Sánchez
Hospital Universitario del Río Hortega, Cirugía General y del Aparato Digestivo, Spain
Aims: Show how technical difficulties when performing certain surgical gestures with the robotic platform are reduced during the umbilical hernia repair.
Methods: A 35 years-old woman with a medical history of hypothyroidism, and without prior surgical procedures. Reffered to the consultation for discomfort associated with primary umbilical hernia, without incarceration crisis. On examination, the patient presented a primary umbilical hernia of diameter 2 cm, which associated large rectus abdominis diastasis. TARUP was proposed, which the patient accepted with prior informed consent.
Results: The procedure was carried out entirely with a robotic platform. The surgical time was a total of 240 min. The use of robot-assisted minimally invasive surgery improved the efficiency of the dissection phase, suture and the ergonomics for the surgeon. The mesh was placed in a retromuscular position. There were no intra- or postoperative complications and the patient was discharged after 48 h.
Conclusion: TARUP technique is reproductible and safe. It avoids the placement of an intraperitoneal mesh, reduces wound complications and the postoperative pain. In addition, the robotic approach allows suturing with more precision and comfort in comparison to conventional laparoscopy. It is probable that in the next years, with an increased availability of robotic platforms and with more surgeons trained and experienced in their utilization, a greater number of hernia repairs will be made using a minimally invasive approach assisted by robot.
Hernia-adhesions—adhesions
V226—Endoscopic approach on incarcerated incisional hernias is the extraperitoneal access feasible?
Juan Bellido Luque, Isabel Cornejo Jurado, Cornejo Jurado, Sanchez-Matamoros, Oliva Mompeán, Nogales Muñoz
Virgen Macarena Hospital, Surgical Department, Spain
Aims: Endoscopic approach in ventral hernia has several advantages over the laparoscopic approach. The intraperitoneal cavity is not accessed and the extraperitoneal mesh placement minimizes the risk of chronic pain and adhesions formation. However, in hernias with incarcerated content, it represents a surgical challenge due to the possibility of injury to this content with the hernia sac reduction maneuvers. Opening the posterior rectus sheath during retrorectal space development in endoscopic approach, the management of the incarcerated hernia contents without risk of visceral injury, is fully feasible.
Methods: We present the case of a 67-year-old male with a history of benign prostate hypertrophy and surgeries for a strangulated right inguinal hernia with intestinal resection by midline laparotomy and laparoscopic left inguinal hernia repair. He went to the emergency room due to abdominal distension and the appearance of nodulation in the median laparotomy scar. On physical examination, he presented a M3W2 6 cms size incisional hernia with partially reducible sac. An abdominal CT was performed: defect width was 6 cm width and 7.5 cm length and no vascular signs from intestinal loops were identified.
Results: totally endoscopic incisional hernia repair was perfumed.
A 2 cm incision was made below the left costal margin and the left anterior rectus sheath was exposed. This layer was incised as close to lateral edge as possible. Retromuscular space was created using ballon trocar. This trocar is removed and one 10 mm trocar was placed for the 30 optic. One 5 mm trocar and one 10 mm trocar were inserted in the left iliac fossa and left hypocondrium, respectively, and a complete left retrorectus space was achieved. The crossover was developed above the level of the umbilicus. Once the medial aspect of the left posterior rectus sheath was incised, preperitoneal dissection was performed, superficial to the falciform ligament. The right posterior rectus sheath was identified and its medial aspect was incised and released in the cephalad to caudal direction. The hernia sac was opened and the hernia content carefully reduced and the upper portion of the right retrorectus space was connected with the lower part of it, completely releasing both right and left retrorectus and preperitoneal spaces.
Once both retrorectus spaces were developed, the posterior rectus sheaths were reapproximated to the midline. Using a nonabsorbable, running barbed suture (V-locTM nº0, Medtronic), the hernia defect was repaired and the posterior rectus sheaths re-joined. The anterior rectus sheaths were then brought to the midline in an attempt to reconstruct the original midline, using the same suture.
The developed retrorectus space was measured (length and width) with a rule in order to use the adequate mesh size to cover it completely. Low-weight polypropylene mesh (Optilene- Mesh elastic, B. Braun) was used. This mesh was rolled and inserted through the 10-mm trocar. The mesh was then properly extended to cover the retrorectus space completely. Cyanocrylate glue (Histoacryl-, B. Braun) was used for mesh fixation. a suction drain was placed. The evacuation of pneumoperitoneum and trocar removal was performed under direct vision. The 10 mm trocar incisions were closed using 2/0 absorbable suture.
Postoperative course was uneventful. The drain was removed and the patient was discharged in POD 1. After 8 months follow-up the patient remains asymptomatic.
Conclusion: Although the totally endoscopic approach is mainly indicated in completely reducible midline hernias, with the opening of the posterior sheath and the hernia defect previously, we can safely handle the incarcerated content without the possibility of visceral injury, continuing with its closure and placement of the mesh in the retromuscular position. With this maneuver, an incarcerated hernia can be managed by a minimally invasive endoscopic technique, minimizing postoperative and chronic pain and the probability of adhesions when compared to the conventional laparoscopic approach.
Hernia-adhesions—adhesions
V227—Laparoscopic transabdominal preperitoneal repair of a Morgagni hernia with defect closure and mesh insertion
Ludovica Baldari1, A. Szold2
1Fondazione IRCCS Ca' Granda Ospedale Maggiore Policlinico Milano, Department of Surgery, Italy. 2Assia Medical Group, Assuta Hospital, Tel Aviv, Assia Medical Group, Department of Surgery, Israel
Aims: Morgagni hernia is a rare congenital defect usually diagnosed and treated during adulthood. To date, there is no consensus on its treatment. The surgical repair can be performed with thoracic or abdominal approach. If compared with the thoracic approach, laparoscopy has several advantages as an easier reduction of the hernia, the possibility to inspect the whole diaphragm to identify other defects and to evaluate, and possibly treat, the abdominal content of the hernia.
This video shows our technique to perform a laparoscopic repair of an anterior diaphragmatic hernia with mesh insertion.
Methods: The patient is placed in supine split-leg position and three trocars are used. We begin with our technique for transversus abdominis plane and retrorectal blocks for pain control. Following, after the reduction of the greater omentum, the hernia sac, with the preperitoneal fat, is completely dissected from the thoracic structures and from the diaphragmatic muscles. The complete mobilization of the sac from the muscles allows a tension free closure of the defect. The defect is closed through a non-resorbable barbed running suture. A 12 cm PVDF mesh is placed on the muscular layer and fixed to the diaphragm and to the abdominal wall with non-absorbable anchors. The peritoneal flap and the mesh are fixed together to the abdominal wall.
Results: The postoperative course was uneventful and the patient was discharged on postoperative day 2.
Conclusions: Laparoscopic transabdominal preperitoneal repair for treatment of Morgagni hernia is safe and associated with several advantages, like diaphragm inspection and evaluation of hernia content.
Hernia-adhesions—emergency surgery
V064—Femoral hernia containing the left Fallopian Tube: a rare finding in an urgent Laparoscopic Hernia Approach
Jesús Cañete Gómez1, Ana García Vico1, J.L. Guerrero Ramírez2
1Hospital universitario de Valme, General Surgery, 2Hospital General de Riotinto, Cirugía General, Spain
Introduction: Femoral hernias are associated with high rates of incarceration therefore they have an increased need for emergency surgical intervention. Different contents in the hernia sac have been described in the literature, but exclusive herniation of the fallopian tube is extremely uncommon due to the normal anatomical position, as it lies at a lower anatomical level than the femoral ring.
Case Report: A 46‐year‐old female presented to the emergency department with a 24‐hour history of a palpable tender swelling in the left groin. She had no significant past medical or surgical history. Physical exam revealed a tender nonpulsatile mass in the left groin area. The mass was painful to palpation. The abdomen was soft, nontender, and without peritoneal signs. A provisional diagnosis of incarcerated femoral hernia was made and the patient was taken to theatre from the emergency department.
Laparoscopic exploration revealed a left femoral hernia containing an incarcerated fallopian tube. She underwent a TAPP hernia repair. Since there were no signs of ischemia, the tube was reducted back into the abdominal cavity and the hernia was repaired. The postoperative course was uneventful, and the patient was discharged on postoperative day two.
Conclusion: Although less common than other forms of hernia, femoral hernia tend to be associated with higher rates of incarceration and subsequent emergency surgical intervention. The diagnosis of entrapped adnexa must be considered in adult women since early diagnosis and surgical treatment are key factors for the prognosis in order to ensure preservation of fertility. Surgical intervention is mandatory to return normal perfusion to the adnexa. At time of operation, if the fallopian tube is deemed viable it should be returned to the pelvic cavity. If there is suspicion of non‐viable changes the structure should be resected.
Hernia-adhesions—emergency surgery
V065—Laparoscopic deinvagination of multiple small bowel intussusceptions associated with Peutz-Jeghers syndrome
Marijus Ambrazevicius1, K. Janonyte2, S. Vilius1, P. Vaitiekunas1
1Klaipeda Republican Hospital, Department of Abdominal and Endoscopic Surgery, 2Vilnius University, Faculty of Medicine, Lithuania
Aims: Peutz-Jeghers syndrome is a rare autosomal dominant polyposis syndrome and characterised by hamartomatous polyps and mucocutaneous pigmentation. The syndrome’s clinical importance arises from complications such as intestinal intussusception and increased rates of malignancy, particularly gastrointestinal.
Methods: 44-year-old female was admitted with sudden onset of abdominal pain, nausea and vomiting. Physical examination revealed mucocutaneous melanin pigmentation around the lips. Patient’s abdomen was distended, tender periumbilically with a palpable mass. Laboratory tests showed microcytic anemia and thrombocytosis. Abdominal and pelvic CT scan revealed a segment of jejunal intussusception with bowel obstruction at the left lower quadrant with a target sign appearance.
Results: Based on the past medical history (in 2017 she was diagnosed with Peutz–Jeghers syndrome (PJS) when endoscopy revealed multiple duodenum and colon polyps), history of the disease (an episode of small bowel intussusception and emergency laparotomy 7 months prior) and current clinical findings, small bowel intussusception was suspected, and the patient underwent emergency laparoscopic surgery. A segment of jejunal intussusception 70 cm from ligamentum of Treitz was found and deinvaginated. The patient had uneventful postoperative recovery and was discharged after 4 days.
Conclusion: PJS polyps are found throughout the gastrointestinal tract, most commonly in the small bowel. They may also be found extraintestinally in the gallbladder, bronchi, bladder, and ureter. PJS polyps are hamartomatous by nature. They predispose to the intussusception, gastrointestinal bleeding and have a higher risk of malignancy. Thus, the prognosis of these patients depends on the patient’s age at the time of diagnosis, the patient’s symptoms, number of polyps, and especially their associated risk for malignancy transformation.
Hernia-adhesions—emergency surgery
V066—Endoscopic preperitoneal aproach in strangulated inguinal hernia
Jorge Zárate Gómez1, Pedro Álvarez de Sierra1, P. Álvarez de Sierra Hernández1, D. Fernández Luengas1, S. Conde Someso1, G. Supelano Eslait1, B. Peinado Iribar1, J.M. Gil Lopez2, J.A. López Baena3, J. Merello Godino1
1H.U. Quirónsalud Madrid, General and Digestive Surgery, 2H.U. Infanta Sofía, General and Digestive Surgery, 3H.U. Gregorio Marañón, General and Digestive Surgery, Spain
We present three ways to repair an strangulated inguinal hernia according to the clinical sympthoms and radiological findings. In a strangulated hernia with no bowel damage and no bowel obstruction, we try to reduce it manually with the help of an endoscopic preperitoneal approach. If we cannot reduce the hernia we make an endoscopic preperitoneal traction or quelotomy to reduce the hernia content, then we will repair the hernia and improve a laparoscopy to explore any bowel damage. If the patient presents a bowel obstruction and a bowel damage, we can also make a first laparoscopic approach to reduce it and resect the isquemic bowel. Then by an endoscopic aproach we can repair the inguinal hernia defect. We seek to show that endoscopic preperitoneal approach in an incarcerated inguinal hernia is safe and possible, allowing us to maintain minimal invasive techniques.
Hernia-adhesions—emergency surgery
V067—Laparoscopic approach in acute intestinal obstruction due to Congenital Internal Hernias
Jacobo Trébol, J. López-Sánchez, A.B. Sánchez-Casado, A. García-Plaza, J.I. González-Muñoz, L. Muñoz-Bellvís
Complejo Asistencial Universitario de Salamanca, General and Digestive Tract Surgery, Spain
Aims: Laparoscopic approach to bowel obstruction is growing for the past two decades. It provides the classical laparoscopic advantages (less postoperative pain, ileus, surgical site infection, incisional hernia, hospital stay and time to resume normal activity; cosmetical benefits) and other specific advantages (quicker return of intestinal function and decreased postoperative adhesion formation). On the other hand, it is technically demanding and is associated with a high conversion rate and higher intraoperative bowel injuries compared to open surgery.
Intraoperative lesions have decreased the last years due to improved technology, more surgeon expertise, and a careful patient selection. Preoperative location diagnosis is very important being sole band adhesion or limited internal hernia one of the most favourable cases. Congenital internal hernias may be good candidates considering that a very long bowel segment could be involved, and that anatomy may be difficult to understand.
We present two patients with late onset limited congenital internal hernias managed successfully with laparoscopy.
Methods: #1: 70-year-old male with 16 h evolution small bowel obstruction with acute renal failure and acute phase reactants elevation. CT showed closed loop occlusion with incipient ischemic changes, probably due to internal hernia.
#2: 54-year-old male with 24 h course bowel obstruction due to a right paraduodenal hernia on CT scan without bowel ischemia.
Both patients were offered laparoscopic exploration.
Results: #1: Three port laparoscopy. A paracecal subtype pericecal hernia is found containing 20 cm of proximal ileum with reversible ischemic changes. Quelotomy for bowel reduction and cecal liberation to prevent recurrences are performed. Operation time 25 min. Uncomplicated postoperative recovery (4 days in hospital) and remains asymptomatic over 4 years later.
#2: Four port laparoscopy. A 4 cm diameter foramen right paraduodenal hernia containing ileum was found. Orifice was in right mesocolon, caudal to ileocolic or right colic vessel. Herniated bowel was reduced, and the opening closed with interrupted 2/0 silk suture. Operation time 45 min. In hospital recovery lasted 6 days with 4 days ileus. Two years follow-up without problems.
Conclsions: Laparoscopic approach is feasible and safe in appropriately selected bowel obstruction due to congenital internal hernias and may provide some advantages for patients.
Hernia-adhesions—emergency surgery
V068—A left paraduodenal hernia: an ‘incidental finding’ in a virgin abdomen with small bowel obstruction
Maaike Vierstraete, H. Maes, E.F.P. Kuppens
AZ Alma, General surgery, Belgium
Introduction: A left paraduodenal hernia (LPDH) is a rare clinical condition, resulting from embryological abnormalities or anomalies of the peritoneal attachments.
Presentation of a case: A 42-year-old man, with negative surgical history, presented to the emergency department with complaints of acute epigastric pain and vomiting. Computed tomography was consistent with (1) a small bowel obstruction, suggestive for closed loop obstruction and (2) identified an incidental LPDH with entrapped small bowel loops though without any pathological signs. An emergency laparoscopy was undertaken revealing a pathological dilated tangle of jejunal loops, with wall narrowing by serosal fibrous bands, located on the efferent side of the LPDH. The latter containing small bowel loops with normal caliber. The small bowels were reduced, and the hernia orifice was closed via non-absorbable sutures to restore normal anatomy. The pathological segment with serosal scar tissue, probably developed secondary to a previous episode of incarceration, was resected.
Discussion: A high level of clinical suspicion for a LPDH is advocated in patients with a virgin abdomen, presenting with recurrent vague abdominal pain or acute symptoms of small bowel obstruction. Usually, a LPDH is an incidental finding on computed tomography imaging or during diagnostic laparoscopy. Surgical repair is the mainstay therapy, even in asymptomatic cases, to prevent future small bowel incarceration which develops in almost half the cases. The laparoscopic approach is feasible and safe, also in an emergency setting.
Conclusion: By presenting this case, we assume to raise awareness as many clinicians are unfamiliar with this rare condition. Clinical suspicion and detailed knowledge of the etiology, anatomy and vascular landmarks allows surgeons to accurately manage a LPDH.

Hernia-adhesions—emergency surgery
V069—Laparoscopic management of a spontaneous Internal Hernia through broad ligament
Miguel Andrei Cesardo Navarrete1, L. Riba Combatti2, J. Comas Issus2, J. Castellvi Valls2
Hospital Moises Broggi, 1Emergency Surgical Department, 2General Surgery And Digestive System, Spain
Introduction: Small bowel obstruction is a relatively common disease with up to 15% of surgical admissions. Internal abdominal hernia constitutes 5 – 8% of cases of intestinal obstruction. Broad ligament as a defect is lower than 4% with intestinal strangulation first described by Quain in 1861 during an autopsy. In 1934 Hunt reported 2 types of broad ligament hernia a complete fenestration or a pouch. Bolin hypothesized that the defect was caused due to trauma from pregnancy and a congenital defect is presumed in its absence.
Case: A previously healthy woman in her late twenties with no prior history of abdominal surgery other than 3 pregnancies was hospitalized in the emergency ward with pain located in the lower abdomen. Admittance to the hospital was due to 24 h of nausea abdominal pain and distension, vital signs were correct with blood tests unremarkable. Abdominal X ray showed bowel distension on the upper left quadrant. After pain subsided with intravenous medicine after re-examination tenderness appeared.
An abdominal CT scan showed a herniated small intestinal loop in the left upper quadrant as well as a loop near the sigmoid colon perceived as an internal hernia.
The patient underwent laparoscopic surgery that showed a distended bowel with signs of edema and vascular congestion. After following the distended bowel a defect in the broad ligament on the left side of the uterus showed to be the cause of the hernia. With gentle traction the hernia was reduced from the defect and after complete bowel inspection the hernia was of the ileum, 60 cm from the ileocecal valve. After close inspection of the defect approximation was done with single stitch using mid-term absorbable braided suture. Before closure the herniated segment of the ileum was inspected showing good color and vascularization.
Conclusion: Internal abdominal hernia is a clinically difficult diagnosis due to atypical presentation with diffuse symptoms and few findings on clinical examination. The main symptom is intermittent signs of intestinal obstruction, but acute abdominal pain is also possible. The gold standard for diagnosis is CT scan but diagnostic laparoscopy is also an option. We conclude that laparoscopic approach is feasible as long as a good relaxation of the patient is achieved and an optimal operative field is available to proceed safely. Also early decision making can provide a better laparoscopic view as the bowel will not be too distended.
Hernia-adhesions—emergency surgery
V155—Successful laparoscopic repair in acute traumatic diaphragmatic hernia
Rocío Pérez Quintero1, A. Ruano-Campos2, I. Domínguez Serrano2, E. Martín Antona2
1Juan Ramón Jiménez, General Surgery, 2Hospital Clínico San Carlos, General Surgery, Spain
Aim: The first description of traumatic diaphragmatic hernias (TDH) is attributed to Sennertus, in 1541. However, it was Ambroise Paré who reported the first case in 1579. TDH present an incidence of 0.8–7% in blunt trauma, reaching 10–15% in penetrating trauma, requiring therefore a high degree of suspicion in order to be detected. This is especially important in severe trauma as they can appear as associated injuries, commonly unappreciated. This entity is considered an indicator of severity in trauma as it appears alongside other lesions in up to 44–94% of cases (1). Early diagnosis is challenging and occurs in less than 50% of patients, resulting therefore in delayed treatment with subsequent increased morbidity and mortality rates.
Method: We present the case of a 59-year-old woman diagnosed with left acute TDH and multiple unilateral rib fractures detected both in chest X-ray (Fig. 1) and urgent computed tomography (CT) (Fig. 2), following blunt trauma due to a car accident. The patient presented with mild abdominal and left thoracic pain, being hemodynamically stable at all times. CT scan revealed a rupture of the middle third of the left diaphragm of up to 10 cm in diameter, with herniation of the whole stomach, as well as fractured left posterior costal arches from the 8th to 11th ribs. Considering all these findings, urgent laparoscopy was decided.
Results: Laparoscopic approach was performed introducing an optical trocar (Optiview), one 10-12 mm and three 5 mm working trocars, observing a central rupture of the left hemidiaphragm (Fig. 3). Diaphragmatic hernia was entirely reduced. Inspection of left thoracic cavity and left chest tube placement (Argylle 20Fr) was carried out. Diaphragmatic defect closure with V-Loc 2/0 absorbable running sutures and Prolene 2/0 non-absorbable single stitches was achieved (Fig. 4). A left subdiaphragmatic drain (Jackson-Pratt 20Fr) was left in place. Postoperative outcome was successful, discharging the patient after an uneventful follow-up on day 5.
Conclusions: TDH are heterogeneous in terms of their mechanism of appearance, chronology, location, and severity. Nevertheless, TDH share a common pathophysiology conditioned by the possibility of herniation of the abdominal contents into the thoracic cavity. Complications due to diaphragmatic rupture are mainly respiratory, including enterothorax associated to strangulation and subsequent necrosis due to herniation of abdominal viscera described in Table 1. There are no signs or symptoms directly attributable to diaphragmatic rupture since most are due to other concomitant injuries. Right-sided injuries seem less symptomatic than left-sided ones, although these last ones are more frequent, representing around 90% of cases. The Organ Injury Scaling Committee of the American Association of Surgery classifies diaphragmatic injuries as described in Table 2, presenting our patient with a grade III.
Diagnosing this entity can be a challenge. X-ray is the initial imaging test, however CT is considered the gold standard diagnostic tool with 100% specificity and 71% sensitivity. Magnetic resonance (MR) can also be very useful, though usually not accessible in this setting.
Urgent surgery is mandatory for the treatment of TDH. Despite various authors advocating laparotomy as the standard approach, it has been demonstrated on account of the increased experience in laparoscopy throughout recent years, that minimally invasive techniques can be applied more frequently, obtaining similar results and providing an early recovery to selected patients (2–4). Standard diaphragmatic repair technique involves non-absorbable sutures. Placement of mesh will depend on several factors including quality of diaphragmatic tissue, defect diameter and concomitant injuries. Nonetheless, its placement remains controversial (5). In our case, closure of diaphragmatic defect was free of tension, consequently we decided not to place a mesh.

Hernia-adhesions—emergency surgery
V156—Laparoscopic repair of combined Gastric and Diaphragmatic Penetrating Injury
Juan Sebastian Malo Corral, J. Hernandez Gutierrez, I. Fraile Alonso, A. Trinidad Borrás, A. Tebar Zamora
Complejo Hospitalario Universitario De Toledo, General and Digestive Surgery, Spain
Introduction: Diaphragmatic injury is a fairly unusual disease. The National Trauma Data Bank (NTDB), have found an overall incidence of diaphragm injury of 0.46 percent. Though initially, diaphragmatic injuries can be obvious, most of the time injuries can be subtle, usually in association with other thoracic and abdominal organs and with high risk of strangulation or herniation of organs if the diagnosis is delayed.
Diaphragm injuries are classified according to the American Association for the Surgery of Trauma (AAST) organ injury scale:
Grade I: Contusion.
Grade II: Laceration ≤ 2 cm.
Grade III: Laceration 2 to 10 cm.
Grade IV: Laceration > 10 cm; tissue loss ≤ 25 cm2.
Grade V: Laceration and tissue loss > 25 cm2.
Also, the mechanism of injury is imperative in determining the extent of the damage. Blunt injuries tend to cause large radial tears of the diaphragm, while penetrating injury leads to smaller rents that approximate the size of the penetrating impalement. Penetrating injuries account for approximately 65 percent of all diaphragmatic injuries.
Laparoscopic repair has been proposed, over the last few years, with good long term outcomes as a safe and efficient technique for the treatment of penetrating diaphragmatic injuries.
Objective To demonstrate the safety and efficacy of the laparoscopic repair of penetrating diaphragmatic injuries.
Materials and Methods: Patient is a 27-year-old male with no significant medical history. Was brought to the Emergency department after having received a stab wound to the left infero lateral thoracic wall after an apparent altercation. He describes the weapon as a 10 cm long sawtooth knife. Chief complaint was severe excruciating diffuse abdominal pain. On physical exam, hemodynamically stable and peritonitis on abdominal examination.
CT of the chest, abdomen and pelvis showed an approximately 2 cm long laceration on the left diaphragm associated with a small amount of pleural effusion and pneumothorax. Small bubbles of extra luminal air suggesting a perforation at the anterior gastric wall.
Results: Given the presentation surgical management was proposed. Complete laparoscopic approach with three trocars with findings of a 2 cm long laceration (Grade II-III) was observed on the anterior left diaphragm with associated partially herniated omentum, as well as 1 cm laceration on the anterior gastric wall at the level of the fundus. Diaphragmatic laceration was primarily repaired with interrupted 2–0 Vicryl sutures. Gastric perforation was primarily repaired with interrupted 2–0 vicryl sutures and reinforced with an omental patch. A left sided chest tube was put in place in the OR.
Postoperative course was complicated with left sided pleural effusion (Clavien Dindo I) which required image guided drainage.
Patient was discharged on post operative day 7.
Conclusion: Laparoscopic approach is a safe and effective method for the treatment of penetrating diaphragmatic injuries.
Hernia-adhesions—emergency surgery
V157—Laparoscopic approach to spontaneous diaphragmatic tearing
Bakarne Ugarte-Sierra, Irune Vicente Rodríguez, N. Ortega Machón, R.A. Abad Alonso, R. Maniega Alba, F.J. Ibáñez Aguirre
Hospital Universitario De Galdakao, General Surgery, Spain
Aim: Show the laparoscopic approach to spontaneous diaphragmatic tearing.
Methods: description in video presentation.
Results: We show the case of a man who suffered a spontaneous diaphragmatic tearing to whom we pushed back the herniated viscera, suture the diaphragmatic defect and place a mesh by a laparoscopic surgical approach.
Conclusions: The laparoscopic approach to spontaneous diaphragmatic tearing is safe and feasible.
Hernia-adhesions—emergency surgery
V158—Laparoscopic repair of strangulated obturator hernia at emergency situation- Our technique and tricks. (Video Case presentation)
Ahmed Elshaer
Gloucestershire Hospitals NHS Trust, Upper GI Surgery, United Kingdom
Background: Obturator hernias are rare, with an incidence of 0.07–1% of all intra-abdominal hernias. They are more commonly seen at thin elderly females. They are usually challenging for both diagnosis and surgical repair, with high morbidity in late diagnosed cases. Hence, the majority (90%) of cases presented late with small bowel obstruction. The awareness of anatomy and pathophysiology of such hernias is essential to tailor its surgical repair. Laparoscopic repair has been described in literature, yet data is scarce with no standard agreed approach.
Methods: We describe a video of our technique for laparoscopic repair of strangulated right obturator hernia which was found to be Richter’s type hernia. An elderly 83 years old female patient presented with small bowel obstruction for 2 days. She noticed lower abdominal pain radiating to medial side of right thigh over last 4 weeks. CT scan confirmed right obturator hernia containing small bowel with transition point at herniated bowel causing small bowel obstruction. Laparoscopic repair of the hernia was done, with TAPP (Transabdominal Pre-Peritoneal) technique and use of mesh. The herniated small bowel was viable but showed severe seromuscular tear with mucosal bulging, therefore an intra-corporeal laparoscopic repair was performed. Postoperatively, the patient had an uneventful recovery.
Conclusion: Diagnosis of obturator hernias is challenging and they are usually discovered at emergency settings. The scarcity of published cases limits our experience to deal with such cases particularly in the emergency situation. Laparoscopic repair could be an optimal repair for such rare type of hernias with favourable outcomes.
Hernia-adhesions—emergency surgery
V228—Intestinal Malrotation—laparoscopic Ladd’s procedure in an adult
Konstantinos Livanos1, I. Tsouknidas2, N. Tasis2, E. Margaris1, I. Oikonomakis3, D. Floros3
1"George Gennimatas" General Hospital, Second Department of Surgery, 2Medical School, National and Kapodistrian University of Athens, Department of Anatomy and Surgical Anatomy, 3401 Army General Hospital, Athens, First Department of Surgery, Greece
Aims: Intestinal malrotation is a congenital malformation that occurs during fetal development. The aim of this video is to present laparoscopic Ladd’s procedure in the rare case of a patient, treated conservatively until the fifth decade of his life.
Methods: We present the case of a 43-year-old male who was admitted to our hospital due to intermittent crampy abdominal pain, nausea and vomiting. He was diagnosed with midgut malrotation at the age of 5. Episodes of vomiting and weight loss in his childhood were treated conservatively by pediatricians. The abdominal computed tomography (CT) scan revealed intestinal malrotation with the characteristic “whirlpool sign” of the mesentery, the “beaking” of the duodenum and the anatomic inversion of the superior mesenteric artery and vein.
During laparoscopy, the cecum was fixed to the right iliac fossa, while the Ladd’s bands were found between the ascending colon and the right lumbar abdominal wall just above the duodenum. The descending portion of duodenum was located in its anatomic region, whereas a part of the small intestine was fixed inferior to the ascending mesocolon. Absence of the hepatic flexure of the colon and missing midgut volvulus were remarkable. A typical laparoscopic Ladd’s procedure was performed; Ladd’s bands were divided and the small intestine was mobilized counterclockwise, while the base of the mesentery was widened. The cecum and the ascending colon were placed to the left abdomen, and the small intestine to the right. Appendectomy was also performed.
Results: The patient had an uncomplicated recovery, tolerating a regular diet on the second postoperative day and being discharged on the fifth day. After two years of follow up, the patient is symptom free.
Conclusion: Midgut malrotation is a rare cause of acute abdomen in adults. Laparoscopic Ladd’s procedure is feasible and beneficial in terms of postoperative pain and early discharge.
Hernia-adhesions—emergency surgery
V229—Small bowel obstruction due to Paracecal hernia: laparoscopic management
Jeancarlos J. Trujillo Díaz, Ruiz-Soriano, Jezieniecki-Fernández, Gómez-Sanz, Cabezudo-Molleda, Herreros-Rodríguez, Montes-Manrique, Núñez-Del Barrio, Beltrán De Heredia – Rentería
Valladolid University Clinic Hospital, General And Digestive Surgery, Spain
Aims: Internal hernias are defined by the protrusion of abdominal viscera through a normal or abnormal peritoneal or mesenteric aperture within the confines of the peritoneal cavity. They are an unusual cause of small bowel obstruction with an incidence of 0.5–5.8%. Unpredictable symptoms make paracecal hernia difficult to diagnose preoperatively. Minimally invasive surgery for acute bowel obstruction is effective in reducing the return of bowel function and postoperative stay. We report a case of small bowel obstruction due to paracecal hernia that was successfully diagnosed and treated with laparoscopic surgery.
Methods: Video presentation.
Rethods: 61-year-old man came to the emergency room due to nausea and vomiting during 10–12 h, associated with abdominal pain and abdominal distention. He had no history of previous abdominal procedures. Physical examination: the abdomen was distended, depressible and generally painful on palpation without signs of peritoneal irritation. An uncomplicated right inguinal hernia was visible and no others abdominal mass or wall hernias were visible or palpable. Blood analysis: Leukocytes: 16,500 Neutrophils: 92% C-reactive protein: 150U/L. Abdominal computed tomography (CT) scan was performed in which significant small bowel distention until the distal ileum was observed, with an area of stenosis (transitional zone) next to the caecum in the right lower abdomen, which is compatible with primary internal hernia. Based on the clinical presentation and abdominal CT, we decided to perform urgent surgical intervention using a laparoscopic approach.
Laparoscopic approach was performed using 3 trocars. Intraoperatively, a segment (aprox. 10 cm) of small bowel loop was trapped in a narrow peritoneal fold in the right paracolic gutter, “paracecal hernia”, the small bowel had signs of intestinal strangulation with serohematic free fluid. The small bowel loop was carefully reduced and after that the hernial defect was enlarged to avoid recurrence. Finally, the small bowel was checked and they appeared with good color and peristalsis.
The patient presented a satisfactory evolution, with improvement in abdominal pain, good oral tolerance and good intestinal transit, clinical and analytical improvement of the inflammatory parameters, she was discharged on the second postoperative day.
Conclusions: Although paracecal hernia is a rare internal hernia, physicians should be aware of it as a differential diagnosis for small bowel obstruction because of its rapid progression to strangulation and necrosis. Laparoscopic approach is effective both for making a definite diagnosis and treating the paracecal hernia, without complications and with the advantages of minimally invasive surgery.
Hernia-adhesions—emergency surgery
V230—Laparoscopic Repair of Diaphragmatic Hernia and Bleeding Splenic Injury in Penetrating Abdominal Trauma
Svetlana Ciocarlan1, Alice Tsai1,2, S. Sasindran2
King's College Hospital, 1Trauma and Acute General Surgery, 2Upper Gastrointestinal Surgery, United Kingdom
Background: Laparotomy / thoracotomy has been the traditional approach to traumatic diaphragmatic and splenic injuries, especially in unstable patients. Open repair of diaphragmatic defects can however be challenging due to difficulty in exposure especially in posterior defects. Laparoscopic approach provides optimal view of the surgical field and potentially reduced post-operative recovery time and length of stay. The aim of the case is to demonstrate the laparoscopic technique in the context of code-red trauma including peri-operative, and technical considerations.
Method: A 29-year-old male motorcyclist who was hit by a car and stabbed in the left posterior chest and flank in an attempted robbery, sustained an open book pelvic fracture, massive left tensioning haemothorax, large diaphragmatic and splenic injury. Emergency laparoscopy was carried out in conjunction with intensive resuscitation and stabilisation in a multidisciplinary approach. Firstly, the patient was put in a reverse Trendelenburg position adjusted for respiratory and hemodynamic stability; split-legged position was not feasible due to pelvic fractures. With adequate exposure, herniation of left liver lobe, shattered spleen, stomach and omentum through the 15 cm posterior diaphragmatic tear was reduced. Active bleeding from the splenic artery was identified and oversewn with 2/0 PDS; shattered segments of spleen was resected, preserving 60%. Finally, diaphragmatic defect was closed with continuous 1 Ethibond suture.
Results: The patient was managed in the intensive care unit post-operatively. Repeated Computerised Tomography scan on post-op day 5 showed an intact diaphragmatic repair, resolving haematoma of the residual spleen and no evidence of undetected intra-abdominal injuries. Clinical care was taken over by Orthopaedic team to manage bony and soft tissue injuries.
Conclusion: Laparoscopy remains an advantageous approach in the acute repair of traumatic diaphragmatic injury with careful patient selection and intraoperative planning. There are few cases reported in the literature. Patient position and surgical field exposure may be restricted in the presence of polytrauma. Multidisciplinary collaboration including trauma anaesthetists and experienced laparoscopic surgeons is paramount to the success.
Hernia-adhesions—inguinal hernia
V116—Surgical technique—TEP inguinal hernioplasty
Javier García-Quijada García, M. González Bocanegra, M. Martín García-Almenta, J. Camuñas Segovia
Hospital Central de la Cruz Roja, San José y Santa Adela, General Surgery, Spain
In this video we show a hernioplasty repair via TEP, describing surgical technique and main anatomic references in a male with a right lateral inguinal hernia.
Hernia-adhesions—inguinal hernia
V117—TEP and Kidney Transplant Recipient
Pedro Alvarez de Sierra, J. Zárate, G. Supelano, B.Peinado, S. Conde, J.M. Gil, J.A. López Baena, D. Fernández Luengas, J. Merello
Hospital Universitario Quironsalud Madrid, Cirugía General y del Aparato Digestivo, Spain
Totally Extra Peritoneal (TEP) technique has become the gold standard approach for a regular uncomplicated unilateral and bilateral inguinal hernia. Previous pelvic surgery implies a relative contraindication for the preperitoneal access, and due to more adhesions and less operating space, there is a higher risk of complications. This approach can be attempted, and performed only in selected cases, by a high experienced team.
This video shows the completion of a TEP procedure in a patient with a previous right pelvic kidney transplant in spite of the anticipated difficulties.
Hernia-adhesions—inguinal hernia
V118—Laparoscopic Transabdominal Preperitoneal (TAPP) repair of Incarcerated Femoral Hernia
Jeancarlos J. Trujillo Díaz, M. Ruiz-Soriano, C. Jezieniecki-Fernández, T. Gómez-Sanz, G. Cabezudo-Molleda, J. Herreros-Rodríguez, M. Montes-Manrique, M. Rodríguez-López, J. Beltrán de Heredia
Valladolid University Clinic Hospital, General and Digestive Surgery, Spain
Aims: Femoral hernias originate from the femoral canal below the inguinal ligament, and constitute about 5% of all inguinal hernias. It is 3–4 times more common in women. The risk of incarceration and strangulation of femoral hernias is high. Thus, intestinal resection is performed more frequently than other inguinal hernias. Repair is more difficult than inguinal hernia because of deeper cavity where hernia occurs and proximity to the major vessels of legs, and the risk of reoccurrence is higher. Diagnosis of incarceration or strangulation can be finalized only during surgical exploration because there may be no significant association between intestinal viability and clinical manifestations. Morbidity and mortality are associated with the feeding of incarcerated bowel, and resection has a significant effect on morbidity. Conventional anterior repair remains the most common treatment used by the surgeon. However, since the appearance of the era of minimally invasive surgery, the criteria or indications for the repair of incarcerated femoral hernia by this approach are still unclear.
Methods: To present an incarcerated femoral hernia case which was treated by laparoscopic method (TAPP) in emergency conditions without resection.
Results: A 70-year-old male patient was admitted to the emergency department with complaints of swelling and pain of the right thigh. The patient expressed in the anamnesis that he has an inguinal swelling for about 1 year, the swelling collapses when applying pressure on it by hand, however, that it did not disappear and pain increased within the last 12 h. He did not express any previous operation in the anamnesis. During physical examination, a rigid painful swelling of approximately 3 cm was palpating in inferior of the right inguinal ligament. Due to this diagnosis, urgent surgical intervention with a minimally invasive approach was decided. Under general anesthesia, the abdomen was entered by the laparoscopic method via umbilical 1 × 12 mm trocar and two auxiliary 5 mm trocars on both flanks. During exploration, a pre-peritoneal fat has entered into the hernia sac through the right femoral canal. The pre-peritoneal space was accessed cutting with a scissor. The peritoneum was dissected. A chelotomy was performed and the incarcerated pre-peritoneal fat and sac was reduced into the abdomen. A prolene mesh was placed in the preperitoneal area covering the inguinal and femoral areas and it was fixated with modified n-butyl-2-cyanoacrylate (Glubran®). The peritoneum was closed using 3/0 monofilament suture.
The patient presented a satisfactory evolution and was discharged on the first postoperative day without complications. No recurrence of hernia was seen during the follow-up period of 12 months.
Conclusions: Strangulated femoral hernia has a high risk of morbidity and mortality. The surgeon on call must have different technical resources in his therapeutic arsenal to deal with this pathology. The TAPP method has superiority over the conventional method in terms of ensuring that intestinal loop is visible during the strangulated femoral hernia repair and that the feeding of the intestine is intact. This method allows us also the possibility of diagnostic laparoscopy for the emergency cases. When there is a need experienced surgeons can easily perform laparoscopic resection and anastomosis in patients with intestinal necrosis or perforation.
Hernia-adhesions—inguinal hernia
V119—Laparoscopic transabdominal preperitoneal (TAPP) repair for giant inguinoscrotal hernia
Riccardo Caruso, V. Ferri, V. Emilio, Y. Quijano, H. Duran, E. Diaz, I. Fabra, L. Malave, R. Agresotti, V. Nola, G. De Nobili
HM Sanchinarro University Hospital, General surgery, Spain
Background: Giant inguinoscrotal (GIS) hernias are rarely encountered in clinical settings and are often associated with mental neglect for many years. This type of hernia is defined as “giant” if it descends below the mid-point of the inner thigh of a patient in an upright position. The laparoscopic repair approach of a GIS hernia is technically challenging. It has been claimed that laparoscopic surgery has several advantages over the open surgical approach, with less pain and an earlier recovery. The aim of this video is to evaluate the efficacy of TAPP (laparoscopic transabdominal preperitoneal) in order to treat a GIS hernia.
Case presentation: A 65-year-old male without a relevant past medical history was admitted to the emergency service with abdominal pain, belching and nausea. He denied any other symptoms, and no previous surgical operations were recorded. Physical examination showed a large mass in the left scrotum below the mid-point of the inner thigh of the patient in an upright position. A CT scan confirmed the diagnosis of a GIS. A laparoscopic TAPP procedure was decided upon as the best course of treatment.
Results: The patient underwent a successful repair procedure. The operation time was 150 min. No intraoperative blood transfusion was necessary. The patient’s diet was resumed on the first day post surgery, and the postoperative hospital stay was three days.
Conclusions: Laparoscopic TAPP repair is a safe and feasible method for surgically managing GIS hernias.
Hernia-adhesions—inguinal hernia
V120—Post Anterior repair Refractory pain and relapse solved by fully Endoscopic or open assisted Mesh Removal and Trans-Abdomino-Preperitoneal repair
Jacobo Trébol, A.B. Sánchez-Casado, A. García-Plaza, J.I. González-Muñoz, A.M. Rodríguez-Rivas, L. Muñoz-Bellvís
Complejo Asistencial Universitario de Salamanca, General and Digestive Tract Surgery, Spain
Aims: Post-hermiorrhaphy chronic inguinal pain is multifactorial, can be disabling, needs multimodal management and may be associated with hernia relapses. Meshes and sutures can contribute causing inflammation or entrapping nerves.
Conservative management includes analgesia and nerve blocks, ablations or neurostimulation.
Surgical treatment includes selective or triple neurectomies, neurolysis or nerve divisions, usually associated with previous mesh removal with or without replacement (often in different planes). Triple neurectomy seems to be the most effective (more than 90% pain relief). Generally, mesh removal alone has worse outcomes.
We present two refractory inguinodinia with relapses managed successfully with mesh removal and TAPP without neurectomies.
Methods: #1: 69-year-old male with bilateral Lichtenstein one year before. He developed severe invalidating neuralgia (needed a walking stick) refractory to Chronic Pain Unit management followed by a hernia relapse.
#2: 54-year-old male with Rutkow-Robbins three years before and immediately invalidating pain unresponsive to conservative therapies.
Both patients were offered laparoscopic TAPP and open groin exploration with mesh removal and eventual nerve transection, planning a laparoscopic retroperitoneal triple neurectomy as plan B.
Results: #1: During TAPP, a direct relapse was identified with the previous mesh on preperitoneal space and some non-absorbable sutures to inguinal ligament. Laparoscopic stitches and nearly total mesh removal (leaving only the part surrounding cord elements) were performed. 15 × 15 cm heavyweight polypropylene mesh was fixed with Glubran2® and flap was sutured. Patient was discharged uneventfully the same day. Physical impairment disappeared immediately, one year without analgesics and two years later mild genitofemoral pain controlled with amitriptilin.
#2: During TAPP a direct relapse appeared medial to the plug which was freed from posterior structures. Non-fixed 12 × 15 cm medium-weight polypropylene mesh was employed, and flap was sutured. Complete meshes were removed by open approach (no nerves were identified) and conjoined muscle was sutured to inguinal ligament (absorbable sutures). Patient was discharged on second day with OMS step 1 analgesics. 10 months later, normal life has been resumed and he only needs acetaminophen po.
Conclusions: For refractory cases, surgery is an option. Although neurectomies with mesh removal offer the best results, a step-up approach could be valid, leaving neurectomies for relapses.
Hernia-adhesions—inguinal hernia
V121—Laparoscopic Trans-Abdomino-Pre-Peritoneal repair in selected Posterior Approach Hernia Relapses
Jacobo Trébol, E. Álvarez-Peña1, A.B. Sánchez-Casado, A. García-Plaza, J.I. González-Muñoz, L, Muñoz-Bellvís
Complejo Asistencial Universitario de Salamanca, General and Digestive Tract Surgery, 1Hospital Universitario La Paz, Madrid, General and Digestive Tract Surgery, Spain
Aims: TAPP offers excellent outcomes on recovery and similar long-term results to open approach. Is particularly indicated in anterior repair recurrences and bilateral defects and to be considered on unilateral primary groin hernia.
It is recommended an anterior approach after a failed posterior repair; TAPP applicability in these situations is controversial.
We present three successful TAPP after previous TAPP, TEP or open mixed anterior–posterior approach.
Methods: #1: 83-year-old male with left anterior tissue repair in 1982, right Lichtenstein in 1997 and bilateral TAPP (recurrences) in 2011. He presented left second recurrence. TAPP was offered because anterior and posterior repair.
#2: 79-year-old male with TEP repair 8 months ago presenting with early relapse. TAPP was indicated due to severe visceral pain.
#3: 74-year-old male with anterior repair (unknown technical details) 12 years ago. TAPP was offered because anterior mesh repair was supposed.
Result: #1: A medial relapse in an area uncovered by mesh was found with adhered sigmoid colon an omentum. TAPP repair with 10 × 10 titanized polypropylene mesh, superposed to the old one, fixed with absorbable tackers and glue. Omentoplasty to cover part of the mesh due to peritoneal rupture. Operation time 65 min. Uncomplicated recovery. Discharge: first day. No relapse in 45 months follow-up.
#2: Lateral relapse with mesh cranial to the defect and incarcerated sigmoid colon. Colon liberation and TAPP with 15 × 15 titanized polypropylene mesh fixed with absorbable tackers and glue were performed. Operation time: 80 min. Discharge: first day. 54 months follow-up without problems.
#3: A mixed anterior–posterior repair with retracted to cavity Polisoft® mesh was found with lateral relapse. TAPP with preperitoneal mesh component removal and substitution with 10 × 15 titanized polypropylene mesh fixed with glue. Epigastric vessels needed to be clipped. Operation time 90 min. Uncomplicated stay, discharge first day and no relapse (24 months follow-up).
Conclusions: In selected cases posterior repair relapses can be managed endoscopically. TAPP was useful to manage incarcerated bowel, to retire securely previous mesh if needed and to analyse relapse causes. These TAPPs maintained endoscopic surgery advantages and obtained excellent long-term results. It is important to anticipate problems to cover the new meshes.
Hernia-adhesions—inguinal hernia
V231—Laparoscopic TAPP plasty of the bilateral inguinal hernias according to the principles of Stoppa's operation
Orest Lerchuk, M. Poryckyy, V. Khomyak1, V. Lukavetskyy1
Lviv Regional Clinical Hospital, Department of Surgery #3, 1Danylo Halytsky Lviv National Medical University, Department of Surgery #1, Ukraine
Endoscopic TAPP and TEP inguinal hernia repair are performed according to the principles of conventional Stoppa's operation, which was introduced by R. Stoppa in 1973. This operation reduced the recurrence rate of inguinal hernias to 1.4%.
Patient B., 70-years-old was admitted to Lviv Regional Clinical Hospital with bilateral reducible inguinal hernia (right sided – M2, left sided hernia – M3). No concomitant cardiorespiratory diseases. The patient was performed bilateral laparoscopic TAPP plastics with the use of one large mesh 24 × 13 cm. The mesh was fixed with vicryl to posterior surface of rectus abdominis muscles. Parietal peritoneum was sutured above the mesh with absorbable V-lock suture. No complications in the postoperative period. On 11 month follow-up no recurrence.
Conclusions. The use of laparoscopic technologies has allowed, in addition to a low recurrence rate, to significantly improve the comfort of the postoperative period, due to a lower percentage of chronic pain and a good cosmetic effect.
Robotics & new techniques—bariatrics
V053—Robotic assisted single Anastomosis Duodeno-Ileal Bypass as a second step surgery after Sleeve Gastrectomy
Anaïs Besa Selva, A. Curell,, V. Gonzabay,, A. Ibarzábal,, J.M. Balibrea,, A.M. Lacy
Hospital Clínic of Barcelona, Gastrointestinal surgery, Spain
Aims: Single-anastomosis duodeno-ileal bypass with sleeve gastrectomy (SADI-S) is a malabsorptive bariatric procedure described in 2007 as a modification of the duodenal switch technique, implying a lower morbi-mortality while maintaining the weight loss and comorbidity resolution.
This procedure can be performed as a single surgical option or as a second step surgery in case of insufficient weight loss, weight regain or in case of severe comorbidities (i.e., diabetes, hypertension).
Robotic platforms allow the surgeon a 3D stereoscopic view, with a greater range of mobility and better surgical precision. Given these benefits, technically challenging surgeries as malabsorptive bariatric procedures may offer improved post-surgical results.
The following video shows a robotic assisted single-anastomosis duodeno-ileal bypass performed in a patient with a previous sleeve gastrectomy (SG).
Methods: We present a 49-year-old patient, with a previous SG and no comorbidities, who had a significant weight regain during follow up. Neither clinical gastroesophageal reflux symptoms nor hiatal hernia where reported. It was decided to perform a conversion to a SADI-S technique with a robotic approach.
The procedure started with properly identifying the ileocecal valve and establishing a total length of 275 cm of the future common limb. The first duodenal portion was dissected after the pylorus and sectioned with a mechanical stapler, preserving the right gastric artery. A duodeno-ileal end-to-side two-layered hand-sewn anastomosis was performed. A leak test with methylene blue was performed, showing no leaks.
Results: The surgery took 215 min (including docking). Patient started oral intake 24 h after surgery and was discharged on the 2nd postoperative day. At the 30 days follow-up, he had lost 11 kg of weight, without experiencing any post-operative complications.
Conslus: Learning about innovative surgical techniques, such as robotic assisted procedures, is a must as it may offer both surgeons and patients better post-surgical results as a minimally invasive technique.
Robotics & new techniques—bariatrics
V054—Robotic-assisted conversion surgery after failed adjustable Gastric Banding
Lavinia Amato, M. Boni, W. Bugiantella, M. De Rosa, L. Mariani, M.T. Federici, G. Metastasio1, G. Ceccarelli
San Giovanni Battista Hospital-Foligno, General Surgery, 1San Matteo degli Infermi Hospital-Spoleto, General Surgery, Italy
Introduction: recently the number of revisional bariatric surgeries has increased considerably, due to technical failures, complications and weight-regain. Minimally invasive revisional bariatric procedures are considered as technically more challenging than primary interventions. The use of robotic technology may provide several advantages compared to conventional laparoscopy.
Methods and results: our surgical team performed about 800 surgical obesity procedures and 900 robotic procedures in a ten-year period, but only in the last 2 years, starting from February 2018 to September 2020, robotic technology was used in selected bariatric patients. Out of 33 cases of robotic-assisted bariatric surgery, 16 (48%) were revisional procedures. There were 11 Gastric Bypass (GB) combined with band removal in patients who had previously undergone Laparoscopic Gastric Banding (LGB); 3 One-Anastomosis Gastric Bypass (OAGB) were performed in patients who had previously undergone Sleeve Gastrectomy (SG); 1 revisional duodenal switch (anastomotic stricture); 1 revisional Roux-en-Y Gastric Bypass for pouch enlargement. All procedures were carried out using Robot-assisted surgery. There was no conversion to open surgery; no patient presented II-IV grade complications according to the Clavien-Dindo Classification. The median operation time was 155 min and the median hospital stay was 3.8 days.
The video shows the main surgical stages of revisional bariatric surgery, highlighting the advantages of a Robot-assisted approach especially in the most demanding surgical procedures.
Conclusions: revisional bariatric surgery using the robotic system is feasible and safe for a wide range of different procedures. Notably, it enhances precision, flexibility and control during anatomical dissection, allowing to better recognize the surgical anatomy following adhesiolysis and improve technical performance in the reconstructive step of an intracorporeal minimally invasive anastomosis. The outstanding advantages of the robotic system compared to conventional laparoscopy become remarkable in revisional bariatric surgery.
Robotics & new techniques—basic and technical research
V232—An innovative technique for extracorporeal knotting in endoscopic surgery
Narendra Lohokare, A.N. Lohokare
Siddhakala Hospital, General, India
Aims & Objective: To introduce an innovative technique of extracorporeal knotting using routine & minimal instruments.
Extracorporeal knotting is a technique used for tying many structures during laparoscopic surgery e.g. Appendicular stump, Cystic duct stump, Vascular stump.
Routinely a knot pusher is used for this purpose.
This Video aims to introduce extracorporeal knotting executed with help of Maryland forceps which is a common laparoscopic instrument.
Methods: Extracorporeal knotting for Appendicular stump or cystic duct stump tying can be done using just Maryland grasper instead of Knot pusher.
After the Roeder’s extracorporeal knot was prepared it was held at the knot with Maryland and introduced through the 5 or 10 mm (via reducer) port. Once the loop position was fixed knot was tied by pushing it by Maryland grasper so as to tighten it in place.
During this maneuver use of Maryland forceps helps to reposition the knot easily if required.
Also use of Maryland forceps makes it easier to handle the stump during knot tying without any need for changing of instrument.
Results & Discussion: This method of tying extracorporeal knots with Maryland grasper was used in more than 500 cases since 2009 for Appendicular stump, cystic duct stump, Indirect hernia sac etc.
Maryland grasper is a very common & regularly used instrument in laparoscopy. Using it for additional purpose of extracorporeal knotting can save on one more instrument (Knot pusher) which actually has only one use.
Also handling of Maryland is usually an easy & a routine affair for laparoscopic surgeons making its use for extracorporeal knotting easier.
There would be an objection that pushing of the knot with Maryland may make the suture weak due to friction of the jaws of Maryland. But holding the knot instead of the suture helps in reducing the friction of jaws with the suture.
Conclusion: The use of Maryland is as convenient as knot pusher for extracorporeal knotting. As a laparoscopic surgeon uses Maryland grasper more often, he or she can be more comfortable using it for extracorporeal knotting.
It also reduces the need to have an extra instrument to be used only for that specific purpose saving on extra expenditures.
Robotics & new techniques—colorectal
V044—Indocyanine green fluorescence-guided robotic TME with coloanal stapled anastomosis for rectal cancer in elderly patient
Giorgio Bianchi1, R. Memeo2, N. de'Angelis1
Ospedale Regionale “F. Miulli”, 1Minimally Invasive and Robotic Digestive Surgery Unit, 2Hepato-Biliary and Pancreatic Surgical Unit, Italy
Aims: We present the case of a 78-year-old male patient (BMI:25.7) diagnosed with a locally-advanced adenocarcinoma of the lower rectum (cT3aN + M0), located 4 cm from the anal verge. Surgery was performed 12 weeks after completion of long-course neoadjuvant chemo-radiation therapy (NCRT). At the restaging MRI, the lesion showed a moderate response (ymrT2N0). After estimating the EuMaRCS score for surgical difficulty (4/10), an “up-to-down” rectal resection was planned.
Methods: The patient was operated on with the da Vinci Xi system® (Intuitive Surgical, Sunnyvale, USA) with a single docking approach.
The procedure was performed following a medial-to-lateral dissection with ligation of the inferior mesenteric artery and vein. The mesorectum dissection was carried out down to the levator ani. The TME was completed with Endo-Wrist robotic stapler transection 1 cm above the dentate line. The surgical specimen was extracted through a 5-cm Pfannentiel incision. Indocyanine Green Fluorescence Angiography (ICG-FA) was used prior to transecting the descending colon, and a stapled, end-to-end coloanal anastomosis was constructed. The diverting ileostomy was fashioned in the right lower abdomen, at the place of port number 2.
Results: The overall operating time was 180 min. The postoperative period was uneventful and the patient was discharged at POD7. The pathology report showed an R0 resection of a pT2N + adenocarcinoma with 2/17 positive lymph nodes.
Conclusion: With its large range of motion and seven degrees of freedom, robotic technology it may contribute to improve precision and easiness during the procedure.
Robotics & new techniques—colorectal
V045—Robotic TME With Enblock Hysterectomy And Bilateral Salpingo-opherectomy For Locally Advanced Rectal Cancer
Mohammed Yousif, M Khawar, M Al Dhaheri, A Ahmed, N AlNaimi, M Abunada, A Parvaiz
Hamad medical corporation, Colorectal Surgery, Qatar
64 year old lady presented with one year history of symptoms of anaemia and change in bowel habits. She denied any obstructive symptoms or rectal bleeding.
She is a diabetic and hypertensive well controlled on medications. She has a past surgical history of open appendectomy. There is no history of weight loss or family history of colorectal cancer. Abdominal and PR exam were completely normal.
Her tumour markers including CEA and CA19.9 were 2.1 and 1.8 respectively. All her other blood tests were within the normal range. Her colonoscopy showed- almost obstructing rectal tumour at 9 cm from anal verge. The scope could not pass beyond the mass.
Biopsy showed high-grade dysplasia. Staging CT chest, abdomen and pelvis with contrast showed no distant metastasis.
MRI rectum showed: a rectal polypoid mass at 10 cm from the anal verge with free circumferential margins, but there was suspicion of anterior margin close to the uterus and left ovary. There were no enlarged lymph nodes and no Extra mural vascular invasion seen on MRI scan. It was reported as T3NO MO.
Her case was discussed in GI MDT and images were reviewed thoroughly. The discussion around the anterior margin being close requiring pre op treatment with Chemo RT vs primary surgery concluded that she would probably benefit from Primary surgery. The option were discussed with her and she opted for the surgery as well as she was not keen on Radiotherapy and consequences of treatment on function of bowel.
At Surgery, she was found to have locally aggressive rectal cancer invading both uterus and left ovary. She underwent an uneventful Robotic anterior pelvic exoneration requiring TME and enblock Hysterectomy with Bilateral salpingo-oophrectomy for anterior rectal cancer invading both uterus and left ovary. Her anastomosis was protected with loop ileostomy.
The patient had a smooth post op course and was discharged on post op day 5.
Her final histopathology showed-Moderately Differentiated Adenocarcinoma,pT4b pN1b (2/19), R0 resection. Her nearest CRM was cleared by 2 cm.
Her case was discussed again in GI MDT and a decision of adjuvant chemotherapy was made.

Robotics & new techniques—colorectal
V070—Laparoscopic Segmental Resection of Transverse Colon using ICG Fluorescence for Lymphatic Maping & Fluorescence Angiography to assess Vascularization
Eugenio Licardie1, I. Alarcón-Del Agua2, M. Sánchez-Ramirez3, S. Morales-Conde2
1Quironsalud Sagrado Corazón, Department of General and Digestive Surgery, 2University Hospital Virgen del Rocio, Seville, Unit of innovation in Minimally Invasive Surgery and Unit of General and Digestive Surgery, 3University Hospital Virgen Macarena, Seville, Unit of General and Digestive Surgery, Spain
Aims: The transverse colon is a rare location for colon cancer and is affected by a poor prognosis. The principle of oncological radicality includes the primary resection of the tumour with an appropriate lymphadenectomy and there is still no consensus on the type of surgical resection to be performed. The lymphatic drainage and vascularization of this section of the colon is very variable and presents different anatomical variants. Three main surgical options are proposed: transverse colon segmental resection, extended right hemicolectomy and subtotal colectomy. In this order, ICG green fluorescence can play a key role, which would help us both to confirm an adequate blood supply to the anastomosis in the case of a segmental resection, and to assist in lymphatic mapping of the area and to ensure adequate lymphadenectomy.
Methods: Male, 55 years old, with no personal history of interest. In colonoscopy, a 35–40 mm polypoid lesion with a 15 mm basis is detected in transverse colon that cannot be removed endoscopically, tattooed proximally and distally. In the abdominal CT the described lesion in transverse colon is evident.
Results: We injected peritumoral ICG in three points in subserosal layer. To allow ICG to extend and identify the lymphatic pattern of this area of the colon, the transverse mesocolon base is exposed identifying a right and a middle colic artery, performing lymphadenectomy of both and section of the right branch of the middle colic artery at its basis, the mesocolon is sectioned including the area stained with ICG fluorescence. Subsequently, ICG fluorescence angiography is performed to check for adequate vascularization prior to performing anatomy. The patient was discharged on the fifth day without complications. AP reported tubulovillous adenoma with low grade epithelial dysplasia. Reactive adenopathies and free resection margins.
Conclusion: Less aggressive surgical procedures, such as segmental resection, may be preferred for early stage tumours; while wider resections should be considered for advanced stages or in emergency surgery presentations. If the oncological criteria for surgery are achieved, no differences related to the type of procedure have been described in the available retrospective studies. We consider that ICG is a very useful tool both for lymphatic mapping and for vascularization assessment of the anastomosis.
Robotics & new techniques—colorectal
V071—Robotic-assisted Rectal Resection with Total Mesorectal Excision (TME) with ICG-fluorescence
Graziano Ceccarelli, W. Bugiantella, L. Amato, L. Mariani, M. Codacci Pisanelli1, M. Boni, M. De Rosa
San Giovanni Battista Hospital, General Surgery, 1Università la Sapienza Roma, Chirurgia Pietro Valdoni, Italy
Aim: Total mesorectal excision (TME) with pre-operative chemoradiotherapy (CRT) when indicated, have to be considered nowaday the key points for treatment of rectal cancer. Despite the demonstrated short-term outcomes benefits of minimally invasive surgery, laparoscopy may be a challenging procedure with a steep learning curve. This in particular for low-lying rectal cancer (≤ 5 cm from anal verge), males and obese patients. Robotic surgery may overcome some of these drowbacks.
Methods and results: A serie of 106 robotic-assisted rectal resections with TME, were performed between January 2011 and July 2020. The serie represented the 59% of all cases operated. The robotic devices used were da Vinci-Si for the first 78 cases and da Vinci-Xi in the last serie. The main indications were: patients with medium–low rectal localization, males, previous chemoradiotherapy (CRT), pelvic lateral lympnode dissection required. Short and long-term outcomes were analized and compared with literaure.
The video shows the main steps of the operation. The duoble doking has to prefer in our experience. After splenic flexure breakdown, and inferior mesenteric vein ligation, the operation is focused on the pelvic region (robotic technology offers advantages within the narrow spaces compared to laparoscopy). The inferior mesenteric artery preparation with hipogastric nerves sparing (if possible), The total mesorectal excision (TME) with its integrity preservation is easily carried on even in narrow male pelvis; thanks to a 3D-view and articulated instruments. The anatomical planes dissected even after radiation therapy. Sometime a pelvic laterl lymph nodes dissection is required. Use of ICG-fluorescence may be useful for a better identification of vascularization of proxiaml colic stump.
Conclusion: Robotic rectal resection with TME has to be considered an interesting alternative to conventional laparoscopic approach. In our experience this technology may reduce conversion rate, and provide better specimen qaulity, especially in more challenging situations (males and low rectal cancers). If that may turn in better oncologic outcomes has to be demonstrated. Nowaday limits are represented by device availability and high costs.
Robotics & new techniques—colorectal
V072—Intracorporeal Resection and Anastomosis in Laparoscopic Left Colectomy as an adaptation to the Sars-Cov-2 (Covid19) Pandemic. Surgical technique
Xavier Serra-Aracil, Irene Gómez Torres, I. Gómez Torres, L. Mora López, A. Pallisera Lloveras, A. Serracant Barrera, A. Garcia Nalda, S. Serra Pla, O. Pino Perez, A. González Costa, M. Muñoz
Hospital Universitari Parc Taulí, Colorectal Surgery Unit. General Surgery Department., Spain
Purpose/Aim: The COVID19 pandemic has forced surgeons to adapt their standard procedures. The modifications introduced are designed to favor minimally invasive surgery. The positive results obtained with intracorporeal resection and anastomosis in the right colon and rectum prompts us to adapt these procedures to the left colon.
The aim of the study is to describe a “don’t touch the bowel technique”, outline the benefits of the use of less surgically aggressive techniques – and also to surgeons in terms of the lower emission of aerosols that might transmit the COVID19 infection.
Our hypothesis is that exteriorization of the colon through an accessory incision increases the risk of tension at the mesocolon level, thus increasing the risk of vascular deficit at the level of the staple area and it may increase the rate of anastomotic leakage.
Methods: Observational study of intracorporeal resection and anastomosis in the left colectomy. We present the selection criteria and describe the technical details of intracorporeal resection, end-to-end stapled anastomosis and extraction of the specimen through minilaparotomy in the ideal location. Preoperative, surgical and postoperative variables are also discussed.
Results: Preliminary results of 25 patients with left-sided colon pathologies, 22 neoplasia, 2 diverticular disease and 1 colonic volvulus, who underwent 5 left hemicolectomies, 10 sigmoidectomies and 10 high anterior resections (Table 1). Median operative time was 190 min (range 120–280). No patient required conversion to extracorporeal laparoscopy or open surgery. Median hospital stay was 4.6 days (range 3—14 days). There were one case of anastomotic leak managed with conservative treatment. (Table 2).
Table 1.
.

Table 2.
.

Conclusion: Intracorporeal resection and end-to-end anastomosis with the possibility of extraction of the specimen by a mini-laparotomy in the ideal location may present benefits and also adapts well to the conditions imposed by the COVID-19 pandemic. Future comparative studies are needed to demonstrate these benefits with respect to extracorporeal anastomosis.
Robotics & new techniques—colorectal
V073—Laparoscopic colonic resection of the Splenic Flexure using Indocyanine Green (ICG) Fluorescence for Lymphatic mapping
Eugenio Licardie1, N .Oliveira2, I. Alarcón-Del Agua2, M. Sanchez-Ramirez3, S. Morales-Conde2
1Quironsalud Sagrado Corazón, Department of General and Digestive Surgery, 2University Hospital Virgen del Rocio, Seville, Unit of innovation in Minimally Invasive Surgery and Unit of General and Digestive Surgery, 3University Hospital Virgen Macarena, Seville, Unit of General and Digestive Surgery, Spain
Aims: Historically, surgical options for malignant tumours of the splenic flexure(SF) of the colon included either a subtotal colectomy or extended left hemicolectomy. Nowadays, it is generally accepted that malignant tumours at the SF can be safely approached by performing a segmental resection, a less aggressive approach achieving similar oncological results. A proper lymphadenectomy during this last approach is done by dissecting the origin of the middle colic artery or the inferior mesenteric artery but preserving both. It can be considered that different tumours, even if located in similar locations, can potentially drain to one or another territory. For this reason, we have observed that peritumoral injection of ICG could determine a tailored lymphadenectomy based on the lymphatic pathway.
Methods: A 71-year-old male was diagnosed with an asymptomatic cancer at the SF of the colon. Preoperative clinical staging by CT-scan was T3N0. The colonoscopy shows a large polyp with biopsy of adenocarcinoma.
Results: We present a laparoscopic segmental colonic resection guided by ICG injected into the peritumoral subserous layer. In order to allow the ICG to spread to identify the lymphatic pattern of this area of the colon, it began with a medial approach preserving the lymphatic drainage and major vessels of the area. ICG was found to diffuse towards the inferior mesenteric artery; a lymphadenectomy was performed at its origin and the left colonic artery transected together with the lymph nodes. ICG fluorescent-angiography was performed to evaluate the vascularization before anastomosis. No postoperative complications were observed and the patient was discharged on the fourth day. Biopsy reported moderately differentiated adenocarcinoma, 20 lymph nodes with no metastasis, pT2N0.
Conclusions: Segmental resection of the colon for SF tumours is a safe procedure with oncological results equivalent to more extensive resections. ICG lymphatic mapping allows a proper lymphadenectomy adapted to each patient individually, as it is based on the specific drainage pattern of each tumour. It helps to decrease the time, complications and morbidity associated with dissection of the arteries near their origin. ICG fluorescent-angiography is a useful, fast and safe test to evaluate the vascularization of the colon before anastomosis.
Robotics & new techniques—colorectal
V074—Robotic right colectomy with complete mesocolic excision (CME) and intracorporeal anastomosis with ICG
Graziano Ceccarelli, L. Amato, W. Bugiantella, M. De Rosa, L. Mariani, M. Codacci Pisanelli1
San Giovanni Battista Hospital, General Surgery, 1University La Sapienza (Rome), General Surgery, Italy
Backround: Several studies have demonstrated a direct correlation between lymph node yield and survival after right colectomy for cancer. Complete mesocolic excision (CME) was demonstarted in several studies to reduce local recurrence if applied in selected cases. The procedure is technically demanding if performed by a minmally invasive approach. Robotic surgery represents an improvement of conventional laparoscopic technology.
Methods and Results: A single surgeon serie of 89 robot-assisted right colectomies were performed between Jenuary 2011 and January 2020; represenitng the 27% of the total right colectomy performed (with open and laparoscopic approach). Intracorporeal anastomosis was performed in 96% of all cases; 31 patients (34%) had a complete mesocolic excision (CME). Indications for robotic approach were besides CME, associated abdomianl surgery (liver resections or others abdominal procedures), obese patients. in 9 of these cases was used the indocyanine green (ICG) for lymphadenectomy too.
This video demonstrates in detail, the case of a robot-assisted right colectomy in a 64-year-old man with a T3 ascending colon adenocarcinoma. The surgical technique was performed using a medio-lateral approach. The CME lymphnode dissection was performed with the aid of ICG-fluorescence; the dye was administered the day before the operation by endoscopy, around the tumor. The minimally invasive CME-dissection is a challenging procedure; the use of robotic 3D-view and the use of robotic articulated instruments allow performing a safety and easily dissection as well as intracorporeal side to side anastomosis. The operative time was 180’, the post-operative course uneventful.
Conclusions: Use of robotic surgery for right colectomy is criticized for its high costs and longer operating time, showing no clear advantaged compared to laparoscopy. In our experience its use may be useful for selected challenging cases, as the CME (when required), associated abdomianl surgeries. Moreover robotic technology may be considered a valuable training tool for the novice robotic surgeons, facilitating the surgical skills, redicing the learning curve in colorectal surgery. Finally the use of ICG-fluorescence has to be considered an interesting tool especially for lymp-node dissection and vascular tissue evaluation.
Robotics & new techniques—colorectal
V075—Indocin green(ICG) guided robotic excision of isolated recurrence in patient with previous colon cancer
Mohammed Yousif, M. Khawar, M. Al Dhaheri, .I Amer, M. Hamad, A. Ahmed, A. Abunada, A. Parvaiz
Hamad Medical corporation, Colorectal surgery, Qatar
This video demonstrates the use of robotic approach in solving a potentially difficult clinical problem in patient with history of previous colon cancer.
A 55-year-old patient initially presented with rectal bleeding in 2018 and was found to have lesion at 12 to 16 cm from anal verge. He underwent an uneventful laparoscopic anterior resection with smooth post op course. His final pathology showed T3 N1a with 1/14 LNs positive. (Stage IIIB).
The patient then received adjuvant chemotherapy (XELOX) 4 cycles.
He has no past medical or family h/o CRC.
Two years later during his follow up visits, he was found to have rising CEA levels from 1.6,6 0.7, 10.2 within three consecutive months.
He underwent a surveillance PET CT scan (Fig. 1) which showed a focal radiotracer uptake of SUV max of 8.3 in a 1.2 cm retroperitoneal lesion next to surgical clips applied at inferior mesenteric artery in the left para-aortic region close to the origin of left common iliac artery, suspicious for a metastatic deposit. No other distant lesions were identified.
He also underwent colonoscopy which was normal. He also had Surveillance CT done which did not show any distant metastases except for the suspected isolated recurrence shown of PET CT scan. His case was then discussed in our GI MDT meeting and a decision of surgical resection of this localized recurrence was made.
The patient was offered a robotic excision of this local recurrence which was seen as an irregular mass lesion at the origin of Inferior mesenteric artery stump. The lesion was localized intraoperatively with the use of an intravenous ICG (Fig. 2). This recurrence was a result of leaving a longer IMA stump and lymph nodes around it.
His post op course went smooth and was discharged home on postop day 2. His final histopathology showed Metastatic adenocarcinoma with prominent mucinous component, measuring 1.2 cm in maximum dimension, in keeping with metastasis from colonic primary.
- 2 negative lymph nodes were also noted (0/2).
The case was rediscussed in the GI MDT and a decision of adjuvant chemotherapy was made.

Robotics & new techniques—colorectal
V095—Totally robotic proctocolectomy and ileo-anal pouch for Familial adenomatous polyposis
Mohammed Yousif, M. Al Dhaheri, M. Khawar, I. Amer, M. Hamad, M. Abunada, A. Parvaiz
Hamad Medical corporation, Colorectal surgery, Qatar
This video demonstrates the stepwise approach to the robotic surgery in the management of familial adenomatous polyposis of the colon and rectum.
A 39-year-old male patient presented with history of rectal bleeding for 2 months. He also had symptoms of anemia as he complained of tiredness and lethargy. His clinical investigation included full colonoscopy and upper G I endoscopy. His colonic examination showed presence of over 100 adenomatous polyps throughout his colon and rectum (Fig. 1). His upper GI endoscopy was normal. The diagnosis of FAP was made and following a normal staging CT scan of abdomen, pelvis and chest, the MDT recommendation was to offer him Proctocolectomy and ileo-anal pouch.
He is hypertensive with no past surgical or family history of colorectal cancer. His lab investigations showed Hb 9.1, Albumin 34, CEA 3.1, CA 19–9 8.9
This video demonstrates the stepwise approach to perform robotic total proctocolectomy and ileo-anal pouch surgery. Da Vinci Xi robotic system with integrated table motion was used to perform double docking procedure. The patient had a smooth post op course and was discharged home on post op day 8.
His final histopathology showed numerous tubular adenomas negative for high grade dysplasia or malignancy. The case was rediscussed in GI MDT meeting and a decision of referral to genetics and G I follow up.
Robotics & new techniques—colorectal
V096—Partial thickness Neuroendocrine tumor exeresis at the level of the rectosigmoid junction using transanal minimally invasive approach (TAMIS)
Javier Valdés Hernández, Y. Lara Fernandez, J.C. Gomez Rosado, M.A. Perez Sanchez, J. Cintas Catena, J.V. Del Rio Lafuente, C. Torres Arcos, A. Cano Matias, F Oliva Mompean
Hospital Universitario Virgen Macarena, General Surgery, Spain
Aim: Transanal minimally invasive approach (TAMIS) is considered for those patients with benign, non-invasive lesions and early stages of rectal cancer, which have a low risk of metastatic lesions, as well as lesions not removable by endoscopy or with affected margins. For these patients, local excision using this technique allows a minimally invasive approach, with less morbidity and mortality, and early recovery.
We present a case of neuroendocrine tumor exeresis using transanal minimally invasive approach after incomplete excision by colonoscopy I which a partial thickness resection was carried out in order to avoid the risk of intraperitoneal perforation due to the location at the rectosigmoid junction and the previous scar.
Methods: 43-year-old male patient undergoing follow-up for positive fecal occult blood test, who was diagnosed with a rectal neuroendocrine tumor after colonoscopy. The lesion was endoscopically resected. Pathology revealed a neuroendocrine tumor with submucosal location. It was well differentiated (G1), with synaptophysin expression and absence of chromogranin in immunohistochemical study, and it contacted the inferior resection plane. In the extension study with computed tomography of the thorax, abdomen and pelvis, and magnetic resonance imaging, no lesions were found. After these findings, he was evaluated by the Colorectal Tumors Committee, deciding to schedule a surgical intervention using transanal minimally invasive approach. The scar was located at the level of the rectosigmoid junction. It was completely resected with a partial thickness exeresis, after injection with gelafundin and perimeter marking, closing the defect with a continuous 3/0 barbed suture.
Results: Rectal bleeding was present in postoperative day one, so a new TAMIS approach for hemosthasia was performed with no further complications. The patient was discharged on postoperative day 5. The pathological result was absence of residual neoplasia. At 6 months follow-up the patients were asymptomatic, without signs of recurrence or metastatic disease in colonoscopy and computed tomography performed.
Conclusions: Transanal minimally invasive surgery is an advanced procedure that allows local excision of lesions and helps overcome technical limitations, morbidity and mortality associated to other resection techniques. TAMIS partial thickness resection is a safe and feasible technique and may be helpful for cases where the risk of perforation is high or when a full thickness excision is not necessary.
The indication must be individualized in each case and assessed by a committee of experts. This surgery approach should be performed by qualified professionals in order to guarantee the success of the technique.
Robotics & new techniques—colorectal
V097—Role of Laparoscopy in removal of Foreign body
Shaiek Aziz Chowdhury
Jalalabad Ragib-Rabeya Medical College & Hospital, Surgery, Bangladesh
A 4 and half years’ old boy presented to me in a private hospital with history of accidental ingestion of foreign body. Then, I decided to evaluate it by Endoscopy. But, eventually, I failed to localize the foreign body upto the duodenum. Furthermore, I decided to do on table C-arm X-ray to reconfirm the presence of Foreign body. And The C-arm X-ray findings confirmed the presence of the foreign body in the left to the midline. Then, I took the decision of going for Laparoscopic removal in same sitting. During the procedure, four 5 mm ports were made and then, enterotomy was made & the foreign body was removed from the jejunum. And the removed foreign body was found to be metallic part of a screw driver. Afterwards, the enterotomy was closed, keeping a drain. And then, ports were closed. The patient was discharged on 4th POD uneventfully.
Minimally invasive surgery is increasing popularity in all arenas of surgery. The combination of Endoscopy & Laparoscopy has made the detection & removal of foreign body much easier with providing much comfort to the patient.

Robotics & new techniques—colorectal
V233—A safer and easier approach to the splenic flexure in colonic resections
Luisana Riba Combatti, H. Gómez Facundo, S. Mompart, L. Ortiz De Zárate, N. Farreras, V. González, F. Mata, L. Viso, J. Mas, J.M. Mullerat, J. Castellví
Consorci Sanitari Integral. Hospital Moisès Broggi, General Surgery, Spain
Mobilization of the splenic flexure of the colon is a standard manoeuvre during colonic resection in benign and malignant conditions. Most surgeons will agree that is one of the most challenging steps in colorectal surgical dissections, due to its difficult access and the close relationship of the colon with other organs.
The aim of this video is to show a variation of the standard laparoscopic technique to detach the splenic flexure, by turning the patient on its right lateral position. This position enables gravity to pull down the small bowel, the transverse colon and the omentum away from the surgical field, allowing for a better view of the splenic flexure and its attachments to the lateral abdominal wall and adjacent structures.
The lateral position also allows gravity to pull down the descending colon, which stays down once detached from its lateral attachments (fascia of Toldt), allowing for less manipulation and trauma to the colon. Our modified technique starts by dissecting the left colon in a proximal direction along Toldt’s fascia, off the lateral abdominal wall and Gerota’s fascia towards the splenic flexure. The extreme lateral position allows for the colon to drop, obtaining a good view of the attachments of the splenic flexure. This allows a safer mobilization of the splenic flexure from the spleen and tail of the pancreas.
Once the splenic flexure is mobilised, the patient is then positioned in the usual prone position to continue the surgical procedure.
We have observed differences in intraoperatory surgical time compared with the standard approach. It allows a quicker, simpler and safer mobilization of the splenic flexure of the colon. The time saved in mobilising the colon is used in changing the patient’s position and re-draping the field. We have observed no changes in anastomotic failure rates, lymph node yield, blood loss, postoperative morbidity, postoperative pain and patient’s length of stay.
Robotics & new techniques—colorectal
V234—Bleeding management after endoscopic polypectomy using TransAnal Minimally Invasive Surgery (TAMIS)
Javier Valdés Hernández, Y. Lara Fernandez, J. Cintas Catena, J.F. Del Rio Lafuente, A. Cano Matías, J.C. Gomez Rosado, C. Torres Arcos, M.A. Perez Sanchez, F. Oliva Mompeán
Hospital Universitario Virgen Macarena, General Surgery, Spain
Aim: Transanal Minimally invasive surgery (TAMIS) is an advanced technique that allows local excision of lesions (benign or early-stage malignant lesions) that would imply a great morbidity for the patient and technical limitations if approached by other techniques. It is a surgical approach that can also be considered for the treatment of other processes such as complications of anastomosis, benign rectal stenosis, rectal ulcers, or bleeding, the reason for this work.
We present a case of post-endoscopic polypectomy bleeding treated by transanal minimally invasive approach.
Methods: 62-year-old patient who in the course of a colorectal cancer screening colonoscopy presented bleeding after endocopic polypectomy 15 cm from the anal margin. Polyps resection was also performed at 20 and 60 cm, without complications. To achieve bleeding control, 8 hemoclips were applied, and epinephrine and hemospray were administered. Despite this, he presented new bleeding with hemodynamic instability, and urgent surgical intervention was indicated. TAMIS approach was performed, with the help of Gel Point Path and pneumorectum, making a double purse string on the lesion with a 3/0 barbed suture, achieving hemostasis. Technical difficulties were encountered due to the location in the rectosigmoid junction. Stenosis was ruled out after suturing with a 19F Foley catheter with a swollen balloon. Another polyp was excised at 10 cm, which was not resected at colonoscopy due to bleeding.
Results: There were no incidents in the postoperative period or new bleeding, being discharged within 72 h, with adequate transit and hemoglobin maintained at 9.6 g/dL. The pathological result revealed an invasive adenocarcinoma on a tubular adenoma with free border (6 mm distance) located at the polyp at 15 cm, for which surveillance and monitoring was decided. Follow-up at 6 months without signs of recurrence or metastatic disease.
Conclusion: Transanal minimally invasive surgery is a viable option for excision of benign or early-stage rectal masses, with mid-term oncologic outcomes comparable to those of radical resection. In addition, it allows the treatment of other benign pathologies, such as bleeding after endoscopic procedures, minimizing morbidity and providing the benefit of a minimally invasive approach. However, for the success of the procedure, it is necessary that it be carried out by experienced teams.
Robotics & new techniques—colorectal
V235—ROBOTIC-ASSISTED RIGHT HEMICOLECTOMY FOR COLON CANCER
Eli Kakiashvili
Galilee Medical Center, General Surgery, Israel
75 year oldZ, male patient presented with melena, without abdominal pain, nausea or vomiting.
Patient uZCnderwent colonoscopy and tumor was found in ascending colon (near the hepatic flexure). Biopsy from the tumor has showed moderately differentiated adenocarcinoma.
His blood laboratory examinations were within normal limits except of Hgb level—11.0. CEA and CEA19-9 were normal.
Abdominal computed tomography was normal.
Patient underwent da Vinci robot-assisted Right hemicolectomy with extracorporeal anastomosis.
Total operating time was 150 min. Three days after operation patient started regular diet and was discharged home on day four.
Final pathology result confirmed diagnosis of moderately differentiated adenocarcinoma.
Robotics & new techniques—colorectal
V236—First Robotic CME in Europe with Auhmented Reality Tools
Thalia Petropoulou1, S. Amin2, A. Polydorou2, D. Miskovits3, J. Fletcher3
Aretaieio University Hospital, Euroclinic Athens, 1Colorectal Surgery, 2general surgery Greece. 2Sheffield teaching hospitals, colorectal surgery, 3St Marks, Colorectal Surgery, United Kingdom
There is a lot of evidence for the benefits of complete mesocolic excision (CME), for increase in survival in patients with right sided colon tumours Nevertheless, it is a technically very demanding operation, which requires experienced surgeons and deep understanding of the anatomy; probably this is one of the reasons that the adoption is still very low. The robotic platform with the technological advantages, such as 3d dimensional view, articulated instruments and precision of movements, could help in better adoption of the technique. Additionally, augmented reality is a growing technology which could help surgeons collaborate all around the world and furthermore develop new skills and techniques.
To our knowledge, in this video, we present the first case of robotic CME in Europe, with the use of augmented reality platform (proximie) and 3d reconstruction of the vascular anatomy. The surgery was performed with live, real time connection, in Athens, Greece, from a certified, experienced robotic colorectal surgeon, with the guidance of an Intuitive proctor from London, UK With the use of the augmented reality platform, both surgeons could communicate during the case and the operating surgeon could see in real time the 3d model and proctor’s suggestions overlaying into her screen. After pneumoperitoneum was created and marking was done, the laparoscopy revealed adhesions of the omentum and small bowel in the area of the tumour and the abdominal wall. A few adhesions are taken down so the robotic platform can be docked to the patient. After the robot is docked, adhesiolysis is continued till the correct plane above the duodenum is identified and developed. Kocher maneuverer is performed and we mobilize all 4 parts of the duodenum and head of pancreas; this is a safety maneuverer so we have access to the vessels in case of injury to any major structures. According to our 3d model, the ileocolic artery (ICA) passes anteriorly to ileocolic vein (ICV). We skeletonize and divide ICA at the origin from superior mesenteric artery (SMA). Then we do the same for ICV, at the origin from superior mesenteric vein (SMV). The right colic artery will be found next. We skeletonize and divide this artery, in its origin. The Henle trunk consists of two separate branches inserting into the SMV. The GEV and a colonic branch draining hepatic flexure and proximal transverse colon. The visible lymph nodes are taken with our specimen. We continue the dissection cranially and we expected and found the middle colic artery and vein trunks, which we will be taking from their origins With the help of the interactive 3d model, we know exactly were we are in every step of the procedure and what to expect. We complete the dissection with the infracolic, suprapancreatic medial to lateral approach that we have described previously and then the lateral dissection. We exteriorize the specimen and we perform a, 2 layered, handsewn, side to side isoperistaltic ileocolic anastomosis. Final pathology revealed a 9 cm ascending colon tumour, T3N0, with 48 lymph nodes harvested and intact mesocolon (Phil Quirke and nick west categorizing quality of specimen: (CME grade I).
Robotics & new techniques—education
V237—Severe intra-operative bleeding during laparoscopic surgery: management and discussion of options – Video presentation
Idan Carmeli, S. Rayman, J. Rachmuth, A. Keidar
Assuta Ashdod University Hospital, General Surgery, Israel
Background: Laparoscopic surgery is currently the preferred approach in most of the procedures done in the general surgery department. As a result, it is common to encounter an intra-operative complication, which can be handled by laparoscopy.
Objectives: To discuss our principals in managing an intra-operative severe bleeding during laparoscopic surgery.
Methods: Edited video presentation.
Discussion: There are some considerations and possibilities for Achieving control of severe bleeding during laparoscopic Surgery. Immediate laparotomy is prompt if the patient is unstable or the surgeon cannot sustain temporary control of the bleeding and therefore laparotomy kit must be at hand or opened. Senior surgeon assistant should be called for. Laparoscopic temporary control is essential and can be achieved by direct or sponge pressure on the bleeding source, or by grasping it with atraumatic grasping forceps. The next step should be to prepare the operation room and staff for a definitive solution. Multiple 12 mm trocars, High-pressure Suction-irrigation system, various sized clip applier and laparoscopic bulldog graspers should be at hand. Further or even complete dissection is prompt to optimize exposure and mobilization. Laparoscopic Definitive control of the bleeding can be achieved by several means: Clipping which is Easy and Available and mainly can be performed during Temporary hemostasis. Questions can arise about its safety. Suturing is safe and Available but there is a need for preparation and achieving Proximal and Distal control for safe suturing. Stapling transection is suitable for un-named vessel or named vessels, which have collateral drainage.
Conclusions: Laparoscopic management of a severe bleeding is feasible and efficient, but require advanced laparoscopic skills and preliminary preparation.
Robotics & new techniques—flexible surgery
V048—Robotic repair of Giant Parasophageal Hernia
Ferney David Gómez Báez, Fulthon Frank Vela Polanco, A. Pinillos Somalo, P. Muriel Álvarez, H. Salvador Roses, J.H. Jara Quezada, F.F. Vela Polanco, A. Escartín Arias, J.J. Olsina Kissler
Hospital Universitari Arnau De Vilanova, General Surgery, Spain
Aims: Paraesophageal hernia corresponds only a 5% of all hiatal hernias, within this group, the type IV is the least frequent. Hernia reduction and fundoplication is the surgical treatment of choice. We present the case of a robotically operated grade IV paraesophageal hernia.
Methods: A 51-year-old male patient without past medical history presenting symptoms of recurrent coughing and bronchitis. He is derived from pulmonology consultations due to findings of grade IV paraesophageal hernia. Surgical treatment is decided. Given the complexity of the hernia the surgical team decided to perform robotic surgery with reduction of a large paraesophageal hernia that contains a transverse colon, closure of the pillars and a Nissen-type fundoplication.
Results: Postoperative time without incidents and he was discharged home on the second postoperative day. Follow-up consultations at 9 months he remains asymptomatic, esophagogastric transit shows good passage of contrast without stenosis, without gastroesophageal reflux or hernia recurrence.
Conclusions: Anti-reflux surgery has evolved in the last decade with the arrived of robotic surgery that offers important technical improvements in the surgical act and allows more complex procedures, with greater precision, such as a grade IV paraesophageal hernia, safely and with good results.
Robotics & new techniques—liver
V043—One stage laparoscopic ICG guided liver resection for bilateral colorectal liver metastases
Matteo Barabino, G. Piccolo, A. Trizzino, M. Mazza, A. Pisani Ceretti, E. De Nicola, G. Scifo, R. Santambrogio1, E. Opocher
San Paolo Hospital—University of MIlan, HPB Surgical Unit, 1Fatebenefratelli Hospital Milan, General Surgery, Italy
Background: Laparoscopic liver surgery has shown a widely diffused use in recent years, owing to its efficiency and safety, which is on par with open surgery [1, 2]. However, certain minimally invasive surgical interventions are yet considered to have a high degree of complexity, and can only be performed in specialized centers.
Challenging surgical interventions include, major resections, minor resections in disadvantageous locations [3], anatomical resections of hepatocellular carcinomas [4], and multiple resections for bilobar hepatic metastases [5]. In these cases, a two-stage approach is preferred, as it is considered to be safer [2]. We present a case report of a full laparoscopic resection of bilobar liver metastases from a rectal adenocarcinoma. A neoadjuvant approach was performed, with indocyanine green fluorescent imaging (ICG) associated with laparoscopic ultrasound (LUS).
Methods: A 63-year-old male patient was hospitalized for the ‘liver first’ treatment of bilobar hepatic metastases from rectal adenocarcinoma (uT3, N2) that was still in situ. The patient underwent initially 4 cycles of neoadjuvant chemotherapy (FOLFOX). At restaging through CT and MRI (iRecist) a partial response was observable, which confirmed the presence of 8 bilobar lesions. These lesions were subsequently treated with ICG guided laparoscopy, through which a non-anatomical resection of S6, a wedge resection of S7 and S8, and a left lateral sectorectomy, were performed.
Results: The operative time was 280 min, and blood loss was 300 ml. The postoperative course was unremarkable and was discharged on the 7th day after surgery.
Conclusions: ICG guided full laparoscopic liver resection for bilobar liver metastases is a safe and effective procedure. Fluorescence could aid surgeons either to better define lesions’ location or to draw a safe line during transection.
References
[1] Koffron AJ, Auffenberg G, Kung R, Abecassis M (2007) Eval- uation of 300 minimally invasive liver resections at a single institution: less is more. Ann Surg 246:385–392
[2] Machado MA, Makdissi FF, Surjan RC, Herman P, Teixeira AR, Machado MC (2009) Laparoscopic resection of left liver seg- ments using the intrahepatic Glissonian approach. Surg Endosc 23:2615–2619
[3] Aldrighetti L, Cipriani F, Fiorentini G, Catena M, Paganelli M and Ratti F. A stepwise learning curve to define the standard for technical improvement in laparoscopic liver resections: complexity-based analysis in 1032 procedures. Updates in Surgery 2019 Jun;71(2):273-283.
[4] Berardi G, Wakabayashi G, Igarashi K, Ozaki T, Toyota N, Tsuchiya A, Nishikawa K. Full Laparoscopic Anatomical Segment 8 Resection for Hepatocellular Carcinoma Using the Glissonian Approach
[5] M. A. Machado, F. F. Makdissi, R. C. Surjan, G. T. Kappaz, N. Yamaguchi Two-stage laparoscopic liver resection for bilateral colorectal liver metastasis Surg Endosc (2010) 24:2044–2047
Robotics & new techniques—liver
V122 - Standardized single port laparoscopy for resection of liver segments 7 and 8: retrospective analysis from a high-volume centre
Christof Mittermair, H. Hoi, M. Grünbart, M. deCillia, T. Hell1, H. Weiss
Saint John of God Hospital, Surgery, 1University of Innsbruck, Department of Mathematics, Austria
Objective: Minimally invasive liver resection has gained wide acceptance over the past few years. Feasibility and safety have been clearly demonstrated. However, lesions in segments 7 and 8 remain a technical hurdle of the method due to the difficult approach in standard multiport laparoscopy. Single incision laparoscopy (SIL) via a subcostal incision potentially abolishes the drawback due to a better dissection route from only one gateway.
Material and Methods: A retrospective analysis of prospectively collected data was conducted. Between 2010 - 2020 all liver resections in segments 7 and 8 were included. SIL procedures were evaluated in depth. Indications, operative technique, intra-operative and perioperative outcome were analysed.
Results: A total number of 105 resections in segment 7 and 8 were conducted in the study period. Of these, 30 were treated by means of SIL. In these resections intrahepatic pedicle occlusion was carried out by means of radiofrequency ablation and/or clips. All could be completed minimally invasive, additional trocars were necessary in 3 patients. The rate of R0 resections was 100% and no intraoperative adverse event was witnessed. Postoperative morbidity yielded 20%, 90-day mortality was zero.
Conclusion: The subcostal SIL approach for liver segment 7 and 8 resections provides comfortable reachability and feasibility. Within these selected cases, all procedures could be completed without significant morbidity.
Robotics & new techniques—liver
V123 - Robot-assisted liver resections; challenging cases presentation
Graziano Ceccarelli, F. Ermili, M. De Rosa, W. Bugiantella, A. Spaziani, M. Codacci Pisanelli1, L. Mariani
Giovan Battista Hospital, Foligno/Spoleto, General Surgery Dep., 1University La Sapienza, Dep. P. Valdoni Chirurgia Generale, Rome, Italy
Background: Benefits of a minimally invasive liver surgery were demo started; however its use is still limited by technical difficulties especially for posterior segments or major hepatectomies. Robot-assisted surgery may represent an important improvement in overcoming some laparoscopic drawbacks.
Methods and results: From March 2012 to September 2020, 141 consecutive patients underwent a robot-assisted liver resection (RALR) at our Surgical Unit. The learning curve for minor resections was quite short compared to laparoscopic one; more challenging cases (according to IWATE and others difficulty score indexes) included major resections, posterior segments, tumor size, vascular involvement, previous abdominal surgery, liver function and associated major abdominal surgery to perform. Data about indications, conversion rate, tumor location, type of resection and associated abdominal diseases treated, were all retrospectively evaluated.
The video shows the main steps of a short series of different cases of challenging liver resections performed using a robot-assisted approach. The vascular control, intraoperative Ultrasound evaluation, and liver transection are sowed step by step.
Conclusions: Robotic liver surgery is a safe procedure with good It short and long-term outcomes. It may represent an important tool to manage the more challenging cases with a minimally invasive approach, especially posterior segments, major resections and associated diseases. The learning curve is shorter in comparison with laparoscopic resections. It is associated to a very low conversion rate.
Robotics & new techniques—liver
V124 - ICG Guided Robotic Left Lateral Segmentectomy for HCC
Valentina Ferraro1, R Memeo1, N de'Angelis2, G Bianchi2, M Tedeschi1, A Casella1, A Libia1.
"F. Miulli Hospital" -Acquaviva delle fonti (Bari) Italy, 1Hepato-Pancreato-Biliary Surgery Unit, 2Colorectal surgery Unit, Italy
Aims: Robotic surgery is increasingly employed in complex procedures such as liver resection. Minor resections of the posterosuperior segments might benefit in particular from a robotic approach, since the size of the incision dominates the postoperative recovery rather than the extent of the resection.
Near-infrared indocyanine green (ICG) fluorescence application in liver cancer surgery have been reported in the literature since 2008. To date, most reports emphasized not only to the safety, feasibility and reproducibility, but also the potential benefits of its clinical applications in term of demarcating segmentation for an anatomical resection, tumor identification to achieve tumor free resection margin, detection of small unidentifiable subcapsular nodules as well as extrahepatic metastatic lesions, and fluorescence cholangiography.
Method: We report the case of a cirrhotic (Child A 6) 72 years old woman underwent to robotic segmentectomy ICG guided for HCC nodule of segment 7. The patient anamnesis revealed a history of chronic hepatitis C viral infection, diabete mellitus. Patient BMI was 42.
Results: Postoperative period was uneventful. Patient was discharged at postoperative day 4. Histopathological (microscopic) features revealed a hepatocellular carcinoma moderatlely differentiared hepatocellular carcinoma.
Conclusion: We aimed to provide a standardized, step-wise guide to robotic liver resection of segment 7 and shows how useful is Near-infrared indocyanine green (ICG) fluorescence application even to achieve negative resection margins.
Robotics & new techniques—liver
V148 - Combined Posterior and Anterior Approach for Laparoscopic Right Hepatectomy
Fernando Burdio, P. Sanchez-Velazquez, B. Ielpo, E. Pueyo
Hospital Del Mar, Surgery, Spain
Background: The Glissonean pedicle approach without dissection of the hepatic pedicle is a straightforward method of anatomical hepatic resection which was first described by Couinaud. However, it is not so popularized because exposition of the intrahepatic pedicle is not always so easy or complete. The unique laparoscopic caudodorsal view has been recently underlined because it also enables a posterior approach of the intrahepatic pedicle. Exposition and section of this Glissonean pedicle could be further improved by initiation the parenchymal division by anterior approach in laparoscopic surgery. New Energy-based technology (Coolingbis®) could make all this procedure easier.
Material and Methods: A 61-year-old female patient (BMI: 31) with 11 colorectal liver metastases with a good response after chemotherapy was scheduled for a radiofrequency ablation of a left lobe metastases followed by laparoscopic right hepatectomy. Patient was prepared according to standard preoperative protocol for a pure laparoscopic surgery. Firstly, the division of the caudate lobe was undertaken and the short hepatic vein ligated. Secondly, cavitation of the anterior part of the liver through the demarcation line was performed and the right intrahepatic pedicle completely dissected off. The right pedicle was clamped to test perfusion with Indocynine green perfusion and cut with linear stapler. Transection of the rest of the demarcation line was undertaken and intrahepatic ligation of the right hepatic vein was performed.
Results: The Pringle maneuver was employed during 15 minutes. The estimated total bleeding was 400 cc and total operative time was 6 hours. Postoperative course was uneventful and the patient was discharged 5 days after surgery.
Conclusions: The combination of posterior and anterior division of the liver parenchyma without previous hilar dissection is actually feasible and could facilitate the intrahepatic transection of large Glissonean pedicles.

Robotics & new techniques—liver
V154—Robotic-Assisted Excision of Common Bile Duct Stricture and Roux-An-Y Hepaticojejunostomy
Eli Kakiashvili
Galilee Medical Center, General Surgery, Israel
29 year old, female patient referred to our institution with common bile duct stricture, caused by iatrogenic injury during laparoscopic cholecystectomy.
During last year, patient suffered from recurrent episodes of ascending cholangitis. Recently, she underwent ERCP and severe stricture of middle CBD was diagnosed. Plastic stent was inserted through the CBD. MRCP also showed severe stricture of CBD with dilatation of biliary tree, proximal to the stricture.
Due to severe and resistant (did not resolved by recurrent dilatation) structure of middle CBD, she was referred to operation.
Patient underwent da Vinci robot-assisted excision of the CBD stricture, hepaticojejunostomy and extracorporeal jejunojejunostomy of Roux-an-Y limb.
Total operating time was 320 min. Day three after operation patient started regular diet and was discharged home on day four.
Final pathology has shoved part of CBD with severe inflammation.
Robotics & new techniques—liver
V169—Robotic-Assisted Extraction of large CBD stones and Choledochoduodenostomy
Eli Kakiashvili
Galilee Medical Center, General Surgery, Israel
63 years old, female patient presented with recurrent right upper quadrant (RUQ) pain, without fever, nausea or vomiting.
30 years ago, patient underwent open cholecystectomy due to cholelithiasis. During last four years, she suffered from recurrent attacks of biliary colic or ascending cholangitis.
Patient several times underwent ERCP and extraction of stones from common bole duct (CBD).
At her last admission, ultrasound (US) revealed recurrent large stones in CBD with significant dilatation of extra and intra hepatic biliary duct (CBD up to 2 cm).
Her blood laboratory examinations showed mild elevation of bilirubin and liver functional tests (LFT'S).
Patient underwent da Vinci robot-assisted choledochotomy, extraction of CBD stones and choledochoduodenostomy.
Total operating time (ORT) was 240 min. Two days after operation patient started regular diet and was discharged home on day four.
Robotics & new techniques—liver
V172—Robotic-Assisted complete excision of Type I Choledochal Cyst and Roux-An-Y Hepaticojejunostomy
Eli Kakiashvili
Galilee Medical Center, General Surgery, Israel
A 30 years old, female patient presented with recurrent right upper quadrant (RUQ) abdominal pain (during last two years), without nausea, vomiting or jaundice. Her blood laboratory examinations were within normal limits, including serum CA 19-9.
Ultrasonography (US) demonstrated a large cystic dilatation of common bile duct (CBD). An abdominal computed tomography scan (CT) and MRCP revealed a type I choledochal cyst, measuring 3.5 cm in diameter.
Patient underwent da Vinci robot-assisted excision of the type I choledochal cyst, hepaticojejunostomy and extracorporeal jejuno-jejunostomy of Roux-an-Y limb.
Total operating time (ORT) was 325 min. Three day after operation patient started regular diet and was discharged on day fife.
Pathology result confirmed choledochal cyst without evidence of malignancy.
Robotics & new techniques—liver
V238—Robotic-assisted laparoscopic anatomic segment 6 liver resection
Pablo Marcos-Santos, D Pacheco-Sánchez, MP Pinto-Fuentes, E Choolani-Bhojwani, F Acebes-García, AD Bueno-Cañones, S Veleda-Belanche, E Asensio-Díaz, M Bailón-Cuadrado, B Pérez-Saborido
Hospital Universitario del Río Hortega, Servicio de Cirugía General y del aparato Digestivo, Spain
Aim: Laparoscopic liver surgery is gaining popularity and technological innovations have contributed immensely to it. Limitations of standard laparoscopic liver surgery can be compensated with robotic assistance. We herein present the case of a patient diagnosed of hepatocarcinoma who underwent a robotic-assisted laparoscopic anatomic segment 6 liver resection as definitive treatment.
Method: 72-year-old man presented with anaemic syndrome. His past medical history revealed chronic liver disease caused by alcohol not treated in the last years. Abdominal CT scan revealed a lesion located in liver segment 6 (size 45 × 40 × 44 mm) that suggested the presence of a tumoral mass matching the description of hepatocarcinoma. Fine needle aspiration biopsy confirmed the diagnosis of low grade hepatocarcinoma. Due to these findings, robotic-assisted laparoscopic anatomic segment 6 liver resection was proposed.
Results: Surgical intervention was performed using da Vinci® X Surgical System. After the creation of pneumoperitoneum with a 12-mm port in the right flank, four additional robotic ports were placed. Intraoperative ultrasound examination was performed to identify segment 6 pedicle. After isolation of the segment 6 pedicle, indocyanine green fluorescence imaging showed that vascularization of this segment did not only depend of its own pedicle. Surgical anatomic resection of segment 6 was made by performing a transfissural approach of its pedicle and segments 5-6 intrafissural vein with hanging manoeuvre. Surgical specimen was extracted by a Pfannenstiel incision. Patient discharge was at 4th postoperative day. Pathology exam revealed the presence of a 5.5 × 3.5 cm low grade hepatocarcinoma (pT1b).
Conclusion(s): Robotic-assisted laparoscopic liver resection has showed no differences compared to standard laparoscopic hepatectomy in open conversion rate, R0 resection rate, hospital length of stay, morbidity and mortality. It definitely offers better visualization as well as 360º endowrist articulated instruments, which overcome the already known shortcomings of laparoscopic and open liver surgery.
Robotics & new techniques—pancreass
V046—Pure Robotic Pancreatico-Duodenectomy with level-3 dissection. “Reconstruction Time”
Beniamino Pascotto, A. Henrard, V. De Blasi, E. Rosso, L. Arru, J.S. Azagra
Centre Hospitalier de Luxembourg, General Minimally Invasive (Laparoscopic and Robotic) Surgery, Luxembourg
This video shows a total robotic pancreatico-duodenectomy with level-3 dissection performed to a 53 years old man with no medical history. The patient underwent to medical observation for progressive jaundice, abdominal pain and weight loss. The medical set-up showed an ulcerated obstructive tumor of the ampulla of Vater. The patient got a stent by ERCP. The biopsy showed a moderately differentiated adenocarcinoma. The CT-Scan showed the absence of metastases. After multidisciplinary discussion we decided to perform a pancreatico-duodenectomy by robotic approach with extended (level-3) dissection.
The video shows the “reconstruction time”. The pancreatico-jejunostomy has been performed with 2 running 3-0 barbed suture 1 posterior and 1 anterior and a “lost” tutor. The same for the hepatico-jejunostomy with 2 running 5-0 barbed suture 1 posterior and 1 anterior and a “lost” tutor. The gastro-jejunostomy was a semi-mechanic anastomosis with a running 3-0 barbed suture to close the enterotomy.
The video shows a step-by-step technic with all the advantages oft he robotic approach for a such difficult surgery.
The patient started to drink the same day of the operation and to eat the 1st postoperative day. The amylases drain dosage at the 3th postoperative day was normal and the drain has been removed at the 4th postoperative day. The patient has been discharged the 8th postoperative day.
Robotics & new techniques—pancreass
V179—Robotic pancreaticoduodenectomy (RPD) for pancreatic adenocarcinoma. The pancreatico-gastric anastomosis: technical details
Graziano Ceccarelli, F Ermili, L Amato, M De Rosa, W Bugiantella, L Mariani, A Bartoli, A Tassi
San Giovanni Battista Hospital, General Surgery, Italy
Aims: Many studies demonstarted that minimally invasive surgery for pancreatic adenocarcinoma has to be considered safe and with equivalent oncologic outcomes as compared to open procedure. Potential benefits may include fewer postoperative complications, shorter hospital length of stay, and decreased postoperative pain. Anyway the minimally invasive approach, especially pancreaticoduodenectomy (PD), remains a technically challenging operation. This is related above all to the pancreatic anastomosis procedure, and the high realted pancreatic fistulas rate, that may compromise the minimally invasive approach. Robotic assisted surgery compared to conventional laparoscopy has demonstred to offer many advantages: high-definition 3-D view, prcise movements, offering a micro-surgery technique, useful in particular during anastomotic steps.
Matherial and Methods: The personal experience in robotic-assisted pancreatic resection includes a short serie of 25 cases between Jenuary 2012 and June 2020; it includs 12 distal pancreatectomy (DP) (with or without splenectomy) and 13 pancreaticoduodenectomies PD). For the last procedure the most common technique of pancreatic stump treatmnet was a pancreatico-jejunal anastomosis, but in the last three cases we performed a pancreatico-gastric anastomosis.
The video shows the main steps of a robotic pancreatico-gastric anastomois for an ampullary tumor (T1 adenocarcinoma). A 65 years-old female was hospitalized for sudden jundice, after endoscopic treatment and imaging evaluation of its operability, the operation was scheduled for a robotic approach; the main steps were: the standard lyphadenectomy, parenchymal transection and en-bloc pancreatic head resection with cholecistectomy, main bile duct and pancreatic istmus dissection; finally the pancreatic stump treatmnet was performed with a gastric anastomosi in the posterior wall. The technique is showed in detail.
Conclusions: Pancreaticoduodenectomy (PD) is a chelelnging procedure especially if performed in a minimally inavsive approach. Robotic surgery (RPD) may reperesent a safe and useful tool for this surgery even in centres with low/medium volume, but high experience in minimally and robotic surgery. The robotic pancreato-gastro anastomosis may be a useful choice in selected cases (soft pancreatic parenchyma).
Robotics & new techniques—pancreass
V180—Robot assisted pancreato-duodenectomy for PDAC in a ninety-year-old patient
Niccolò Furbetta, Matteo Palmeri, S. Guadagni, D. Gianardi, G. Di Franco, M Bianchini, A. Comandatore, V. Pucci, L.M. Fatucchi, G. Boni, F. Vagelli, G. Di Candio, L. Morelli
University of Pisa, General Surgery Unit, Department of Surgery, Translational Research and New Technologies in Medicine, Italy
Aims: If on the one hand it is well known that minimally invasive surgery guarantees important advantages especially in delicate patients such as the elderly, on the other hand robotic technology gives some advantages in pancreatic surgery allowing to perform challenging procedures, such as pancreato-duodenectomy. We are presenting a case of a pancreatic ductal adenocarcinoma (PDAC) treated with a full robotic Traverso-Longmire (T-L) pancreato-duodenectomy in a ninety-years-old patient.
Methods: A 90-years old man with a finding of a PDAC of the head of the pancreas underwent a robot-assisted pancreato-duodenectomy. The procedure was performed with the da Vinci Xi platform and the use of the EndoWrist Vessel Sealer Extend. Patient was placed in lithotomic position and robotic trocars were placed on the transverse umbilical line.
Results: The procedure was successfully completed in 435 min. Console time was 240 min. The dissection of the pancreatic head from the portal vein, the section of the retro portal lamina, as well as the lymphadenectomy, were entirely performed with the EndoWrist Vessel Sealer Extend device, avoiding any ligation or clips application. A personal modified end-to-side pancreatojejunostomy with 3/0 V-Lok double layer suture was carried out. No intra-operative complications occurred and no conversions to laparoscopy or laparotomy were required. The postoperative course was uneventful and the patient was discharged on the 8th POD.
Conclusions: In our experience, robotic surgery allows to exploit the recognized advantages of minimally invasive surgery in fragile patients, even in the execution of a complex surgical procedure. The use of the fully wristed Vessel Sealer Extend makes easier difficult maneuvers, enabling an optimized approach for vessels sealing and cutting and for tissue bundles.
Robotics & new techniques—pancreass
V182—Robotic Approach in the reconstructive phase of Cephalic Pancreaticoduodenectomy
Fernando Acebes-García, Pablo Marcos-Santos, D. Pacheco-Sánchez, P. Pinto-Fuentes, E. Choolani-Bhojwani, P. Marcos-Santos, A.D. Bueno-Cañones, S. Veleda-Belanche, M. Toledano-Trincado
Río Hortega University Hospital, Digestive and General Surgery, Spain
Cephalic pancreaticoduodenectomy (Whipple procedure) is known to be the only curative surgical option and also provides an increase in the long term survival for patients with pancreatic head or periampular cancer.
However, Whipple procedure has a non-despicable morbimortality rate. Among the newest advances, it has been proved that taking the procedures into hospitals which have a high volume of cases and teams with wide experience, is related to a decrease of mortality under 5% and morbidity under 40%.
On the other side, some modifications proposed to the original technique, which was initially described by Whipple, have not shown significant differences in morbimortality in experienced surgical groups. Nevertheless, there are uncountable variants of the surgical technique.
The first laparoscopic Whipple surgery was performed in the 90 s. Nevertheless, due to the complexity of the procedure and the increased number of cases required to carry out this surgery safely, there are only a few teams which perform this approach worldwide. However, with the emergence of robotic as a new and minimal invasive approach, a new stage is opened, which undoubtedly has the benefits of minimal invasive surgery and also reduces the learning curve and overcomes the outcomes of morbimortality in comparison with the laparoscopic approach.
In this video, we introduce the case of a patient with an ampuloma with bile duct and pancreatic head infiltration, in which a complete cephalic pancreaticoduodenectomy with lymphadenectomy, assisted by the robotic system Da Vinci X, was made. We can see the advantages the robotic approach offers during the reconstructive phase of the technique, being a possible alternative in selected patients.
Robotics & new techniques—pancreass
V184—Robotic Approach in the resective phase of Cephalic Pancreaticoduodenectomy
Fernando Acebes-García, Pablo Marcos-Santos, D. Pacheco-Sánchez, P. Pinto-Fuentes, E.Choolani-Bhojwani, P. Marcos-Santos, A.D. Bueno-Cañones, S. Veleda-Belanche, M. Toledano-Trincado
Río Hortega University Hospital, Digestive and General Surgery, Spain
Cephalic pancreaticoduodenectomy (Whipple procedure) is known to be the only curative surgical option and also provides an increase in the long term survival for patients with pancreatic head or periampular cancer.
However, Whipple procedure has a non-despicable morbimortality rate. Among the newest advances, it has been proved that taking the procedures into hospitals which have a high volume of cases and teams with wide experience, is related to a decrease of mortality under 5% and morbidity under 40%.
On the other side, some modifications proposed to the original technique, which was initially described by Whipple, have not shown significant differences in morbimortality in experienced surgical groups. Nevertheless, there are uncountable variants of the surgical technique.
The first laparoscopic Whipple surgery was performed in the 90 s. Nevertheless, due to the complexity of the procedure and the increased number of cases required to carry out this surgery safely, there are only a few teams which perform this approach worldwide. However, with the emergence of robotic as a new and minimal invasive approach, a new stage is opened, which undoubtedly has the benefits of minimal invasive surgery and also reduces the learning curve and overcomes the outcomes of morbimortality in comparison with the laparoscopic approach.
In this video, we introduce the case of a patient with an ampuloma with bile duct and pancreatic head infiltration, in which a complete cephalic pancreaticoduodenectomy with lymphadenectomy, assisted by the robotic system Da Vinci X, was made. We can see the advantages of the robotic approach during the resective phase of the technique, including the lymphadenectomy, being a possible alternative in selected patients.
Robotics & new techniques—solid organs
V239—Laparoscopic resection of a retroperitoneal schwannoma
Ludovica Baldari1, A Szold2
1Fondazione IRCCS Ca' Granda Ospedale Maggiore Policlinico Milano, Department of Surgery, Italy. 2Assia Medical Group, Assuta Hospital, Tel Aviv, Assia Medical Group, Department of Surgery, Israel
Aims: Schwannoma is a rare tumor occurring in the retroperitoneal space, that can be removed with several techniques depending on location and size. This video shows our technique to perform a laparoscopic resection of a retroperitoneal tumor.
Methods: The patient is a 38-year-old man with several months’ history of back pain. Abdominal CT scan revealed the presence of a 70 × 42x35 mm retroperitoneal mass next to the left side of the aorta and posterior to the left renal vein. Potential approaches could be thoracic, thoraco-abdominal, and abdominal. We elected the abdominal laparoscopic approach because of the proximity to renal vessels and tumor’s deep location.
Patient was placed in 90 degrees right lateral position and four trocars were used: 10 mm trocar in the umbilical region, three 5 mm trocars in the left upper quadrant, epigastrium and infra-umbilical. The procedure starts with the section of the phrenicosplenic and phrenicocolic ligaments which allows the mobilization of the spleen and the left colonic flexure. The perirenal fat is dissected and the left kidney is completely mobilized from the lateral and posterior wall and then is reflected medially. The medialization of left kidney allows the identification of the mass. The muscular plane is split anterior to the tumor, allowing its complete dissection. Subsequently, the diaphragmatic muscular plane is closed using a running barbed suture. The specimen is removed with an endobag through a mini-laparotomy.
Results: The post-operative course was uneventful and the patient was discharged on post-operative day two. Histopathological examination reported the presence of a benign schwannoma.
Conclusions: Laparoscopic approach is a safe technique for excision of retroperitoneal schwannoma allowing control of abdominal vessels.
Robotics & new techniques—technology
V050—Use of ICG-mode to visualize white light to assist esophago-gastric surgical procedures
Rodrigo Kaibel1, E. Licardie2, M. Socas3, F. López-Bernal3, I. Alarcón3, S Morales-Conde3
1Hospital POVISA, Vigo, General and Digestive Surgery, 2Quironsalud Sagrado Corazón, Seville, General and Digestive Surgery, 3University Hospital Virgen del Rocío, Seville, Unit of innovation in Minimally Invasive Surgery and Unit of General and Digestive Surgery, Spain
Introduction: Esophago-gastric procedures are performed many times under the assistance of oro-gastric tube or even flexible endoscopy. This assistance is needed to guide the surgical procedure or to detect different complications. Conventional orogastric tubes are difficult to identify and the white light of the endoscope needs to be identified by reducing the light of the laparoscopic lights which is uncomfortable and needs many adjustments of the quantity of light during the procedure.
Aims: Analyze the usefulness of the “indocianine green” (ICG) mode of the laparoscopic unit to visualize the white light of the flexible endoscope or of a special orogastric tube with light during several esophago-gastric procedures.
Methods: We presente different surgical procedures under the assistance of a flexible endoscope (a Heller myotomy for achalasia), and a Fouchet tube with white light (sleeve gastrectomy, gastric by-pass, re-do of a Nissen fundoplication, enucleation of esophageal leiomyoma). With light under the ICG mode is seen in green being easier to be identified and to work without external assistance and under safer conditions.
Results: The white light is seen much better with the ICG mode than with the conventional view, allowing us to:
- identified the location of the Fouchet during the whole procedure, visualizing the green light through the esophageal and the gastric wall, guiding in a easier way the tube towards the antrum, the esophagus or the jejunum.
- reposition of the tube when it moves back from the original position allowing a proper control of the procedure.
- adjust the endoGIA stapler to the tube during a sleeve gastrectomy or a gastric by-pass.
- control the entrance and exit of the tube through the Nissen fundoplication and through the gastro-yeyunal anastomosis of the gastric by-pass.
- identify esophageal perforations during and after an esophageal dissection.
- identify areas of stenosis or dilatation offering a proper calibration during a sleeve gastrectomy or a Nisse fundoplication when closing the crura.
Conclusions: The white light of the Fouchet tube or the flexible endoscope is visualized better under the ICG mode, which increases the safety of esophago-gastric procedures.
Robotics & new techniques—technology
V051—Laparoscopic ligation of Inferior Mesenteric and Lumbar Arteries with Indocyanine Green Fluorescence imaging in patient with endoleak Type II
Javier Valdes1, 2, A. Ramirez2, F. Del Rio2, C. Velazquez3, F. Oliva2
P Virgen Macarena University Hospital, 1Colorectal Surgery Department. 2General And Digestive Surgery Departmente, 3Cardiovascular Surgery Department, Spain
Aims: Endoleak is the most common complication after endovascular aortic aneurysm repair (EVAR). Type II is the most frequent endoleak, in which retrograde flow persists to the aneurysm sac derived from the inferior mesenteric artery (IMA) and/or lumbar artery. Surgery is reserved for cases of sac growth or when the endovascular treatment fails. Nowadays, the treatment of type II endoleaks has been facilitated thanks to the advances of laparoscopy and the appearance of indocyanine green.
Methods: We report an advance laparascopy case with ligation of the inferior mesenteric artery at its origin and of the lumbar arteries using fluorescence-guided angiography with indocyanine green in order to confirm the flow of the aneurysmal sac.
Result: Surgery time: 60 min. Bleeding less than 100 cc. 25 mcg of green intraoperative intravenous indocyanine, checking cessation of retrograde flow to the aneurysm sac. Hospital discharge in 24 h without complications.
Conclusion: Ligation of the IMA and the lumbar arteries by using indocyanine green-guided laparoscopic surgery is a safe and effective technique in patients with type II endoleaks. It is more useful if the aneurysmal sac has grown. Although this type of technique must be performed in centers with high experience in advanced laparoscopy and with a great strategy.
Robotics & new techniques
V240—Pressurized Intraperitoneal Aerosol Chemotherapy (PIPAC) in rectal cancer patient with peritoneal metastasis
Andrea Biancucci, A. Fassari, M.M. Lirici
San Giovanni—Addolorata Hospital Complex, Department of Oncologic Surgery, Italy
Aim: Pressurized intraperitoneal aerosol chemotherapy (PIPAC) in combination with systemic chemotherapy is a bidirectional novel treatment approach for patients with peritoneal metastasis who do not meet the criteria for cytoreductive surgery (CRS) with hyperthermic intraperitoneal chemotherapy (HIPEC).
Methods: This is the case of a 50-year, otherwise well-being man, referred in July 2018 to our hospital with evidence of advanced occluding rectal cancer and peritoneal metastasis. The patient was presented to the multidisciplinary tumor-board: given the extent of disease a diverting colostomy was placed and successively a systemic neoadjuvant chemoradiation (Capecitabine + 5000 Gy) was carried out with pathological partial response. In November 2018 he underwent a Transanal Total Mesorectal Excision (TaTME) with permanent colostomy fashioned for uncertain residual of Denonvilliers fascia and prostatic plane. The pathology report showed a moderately differentiated invasive adenocarcinoma staged as ypT3, ypN0, Rx; Mandard tumor regression grade 3. Postoperative adjuvant Capecitabine chemotherapy was administered from December 2018 to April 2019. Close follow-up examinations showed a radiological complete regression until May 2020 when abdominal CT-scan demonstrated the presence of pelvic recurrence. Peritoneal disease progression was observed from June to September 2020, despite a first line chemotherapy (FOLFOX regimen) and a second line treatment (FOLFIRI regimen).
PIPAC was first performed in November 2020 according to standard protocols. Two double-balloon airtight trocars were used: the first one for the camera connected to the CO2 insufflator, the second one, connected to a closed aerosol waste system (CAWS), for working instruments and the micropump nebulizer used for delivering chemotherapy under pressure. Laparoscopic evaluation of peritoneal metastasis extension according to the Sugarbaker Peritoneal Cancer Index (PCI) was performed: tumor nodules were observed on the greater omentum, in pelvis and on the diaphragmatic surface and the PCI-score calculated was 13. Ascitic fluid was drained and sample peritoneal biopsies were taken to assess Peritoneal Regression Grading Score. The pressurized aerosol containing Oxaliplatin at a dosage of 92 mg/m2 BSA diluted in saline solution was administered inside the peritoneal cavity for 5 min. Afterward, 30 min CO2 insufflation under laparoscopic guidance was kept for aerosolized chemotherapy diffusion. At the end, the toxic aerosol was safely removed via CAWS.
Results: Total operative time was 40 min. Postoperative course was uneventful with patient discharged on postoperative day 3. Patient is scheduled for further 2 PIPAC procedures at 6 weeks intervals.
Conclusions: PIPAC is safe and well tolerated, has been validated for palliative treatment of ascites in patients with peritoneal carcinosis not responding to standard chemotherapy. In the last years several ongoing trials are carried on assessing the effectiveness of PIPAC in boosting tumor regression in association with second or third line chemotherapy.
Solid organs—adrenal
V019—Functioning Retroperitoneal Paraganglioma. Laparoscopic Resection
Pedro Alvarez de Sierra, J. Zárate, G. Supelano, B. Peinado, S. Conde, JM Gil López, J.A. López Baena, D. Fernández Luengas, J. Merello
Hospital Universitario Quironsalud Madrid, Cirugía General y del Aparato Digestivo, Spain
We present this surgical video of a retroduodenal 5 cm interaortocaval functioning paraganglioma in a 46 year old female. After an image finding and the following functional, serological and radiological tests, we reached this diagnosis. The only clinical feature was hypertension.
Paragangliomas may appear along the spinal axis, in this case it was located in retroperitoneum and was succesfully resected with an uneventful postoperative recovery and long term normal catecholamine levels.
Solid organs—adrenal
V020—Right adrenalectomy for large metastatic cancer with the posterior retroperitoneoscopic minimally invasive technique
Richard van Hillegersberg1, Aristoteles Kechagias2, M. Vriens1, I. Borel Rinkes1, I. Rouvelas3, N. Kritikos3
A Tamper University, Department of Gastrointestinal Surgical Oncology, The Netherlands
1Universitair Medisch Centrum Utrecht, Department of Gastrointestinal Surgical Oncology, The Netherlands. 2Tamper University, Department of Gastrointestinal Surgical Oncology, Finland. 3USA
Background: The adrenal gland is an upper-abdomen organ, located at the posterior retroperitoneal space. Adrenalectomy with the traditional transabdominal laparoscopic (TTLA) technique may be challenging, in particular for the resection of large tumors. TTLA comprises the surgical mobilization of all the abdominal organs situated in front of the adrenal, with the addition of adhesiolysis in the case of previous transabdominal operations. On the contrary, the posterior retroperitoneoscopic adrenalectomy (PRA) is a minimally invasive technique that provides direct access to the retroperitoneum. In PRA the adrenal resection is achieved without any other-organ mobilization or adhesiolysis with a drawback of limited operative space. Concerning large unilateral adrenal masses (> 6 cm) where cancer is suspected open surgery is still an acceptable option according to the latest European Society of Endocrinology Clinical Practice Guideline. The rationale is that with increasing tumor size there is higher risk for tumor capsule rupture and recurrence if minimally invasive surgery is performed.
Aim: We present a video of a right PRA for a 6.3 cm metastatic adrenal cancer with the novelty of left-handed dissection (LHD) on the crucial structures of the vena cava and the right adrenal vein. We aim to show that PRA and an intact surgical specimen are feasible even for large adrenal tumors (> 6 cm) and that sufficient working space is achieved with the use of LHD in a right-sided procedure.
Procedure: The right PRA is performed in a patient with a large mass at the right adrenal with the suspicion of rectal cancer metastasis. In the past, the patient underwent low anterior resection of the rectum for cancer. As shown in picture 1, the patient is in prone position and 3 ports are used in the right back subcostal area with the camera in the middle port. The proximity of the left port (surgeon’s left hand) to the vena cava and to the adrenal vein is obvious. Instead, the adrenal mass is in the way between the right port (surgeon’s right hand) and the crucial veins, creating a challenge for a right-handed dissection on the structures medial to the adrenal.
In our video, the dissection starts medially to the adrenal with the use of the (right-handed) surgeon’s left hand. The posterior surface of the vena cava is fully exposed and freed from any tissues, the adrenal hilum is freed intact, and the right adrenal vein is divided. LHD is continued to fully mobilize the adrenal. The intact surgical specimen is removed with an endo-basket.
Conclusion: Left-handed dissection facilitates the crucial medial dissection in right-sided PRA for the resection of large adrenal mass. The use of LHD overcomes the challenge of limited operative space or of the bulging of the adrenal mass in right PRA. The advantages of minimally-invasive PRA should be considered also in patients with a large mass located in the adrenal.
Solid organs—adrenal
V021—Laparoscopic resection of extra-adrenal pheochromocytoma (paraganglioma)
Anna Rzepa, J. Rymarowicz, T. Wikar, M. Pisarska-Adamczyk, M. Matyja, M. Wierdak, M. Pędziwiatr
University Hospital in Cracow, IInd Department of Surgery, Poland
Introduction: Paraganglioma is a neoplasm that grows from cells near the ganglia. The most common location of the paraganglioma in the abdominal cavity is the adrenal gland, an extra-adrenal location is extremely rare.
Material and Methods: The patient is a 33-year-old man with the history of long-term malignant arterial hypertension and persistent headaches. Abdominal computed tomography showed 5 cm tumor located in the abdominal cavity near the aorta (paraganglioma susp). Patient was qualified to laparoscopic removal of the tumor.
Results: Procedure started with a diagnostic laparoscopy that showed the tumor between vena cava and aorta. Careful dissection was performed in order to isolate the growth, the most common instrument used was the harmonic scalpel. The vessels were transected using a vessel clips. The specimen was retrieved in an endobag through the minilaparotomy. Patient was discharged on the second operation day. Pathomorphological examination showed that the removed tumor was catecholamin-producing paraganglioma.
Conclusion: This video shows the technical details of a laparoscopic approach to such unique tumors. Laparoscopy enables delicate and precise dissection and manipulation, extremely important in case of catecholamine-producing tumors.
Solid organs—adrenal
V022—Utility of indocyanine green for intraoperative localization of vascular relations during a surgery of a rare extra-adrenal ganglioneuroblastoma
Julio Gómez-Menchero, J.L. Guerrero, A. Gila Bohorquez, J.M. Suarez Grau, J.A. Bellido Luque
Hospital de Riotinto, Surgery, Spain
Aims: Ganglioneuroblastoma is a primary malignant tumor of the sympathetic nervous system. It usually occurs in children and is extremely rare in adults. Here, we report a case of an extra-adrenal ganglioneuroblastoma in a 50-year-old woman and the surgical procedure using ICG-enhanced fluorescence imaging for an adequate mapping of the vascular relationship of the tumor during the resection performed by laparoscopic approach.
Methods: A female 50 years old affected by abdminal pain and sick is evaluated in our office. A CT scan is performed that shows an extraadrenal mass of 40 × 24 mm located near to pancreas and between the left diaphragm pillar and the left adrenal gland and spleen. RM confirmed the relations of thr mass.
Blood concentration of cortisol and dehydroepiandrosterone sulfate were not significantly elevated. Aldosterone was 11 ng/dL and plasma renin concentration were 9.2 mcU/mL. Twenty-four-hour urine studies included vanillylmandelic acid 10.7 mg), metanephrine 116 mcg, normetanephrine 594 mcg and chromogranin which were all found to be normal. Urinary free cortisol was normal too.
Results: Preoperative α-receptor blockade was achieved with prazosin. A laparoscopic approach was performed using an umbilical 11 mm port, 5 mm port in right paraumbilicus position and subxiphoid, and a 12 mm in left paraumbilicus.
An anterior and retropancreatic dissection combined was performed using a Ligasure Maryland (Covidien Medtronic-USA) and an angiographic ICG-enhanced Fluorescence imagen was developed in order to identify the splenic Vein and Common hepatic artery and celiac trunk during the surgical procedure.
Conclusions: In view of its “angiographic” properties, ICG-enhanced fluorescence imaging is useful to facilitate vascular dissection. This has been shown to be helpful under certain conditions when there is reason to suspect the presence of anatomical variations. And allow us to develop safer procedures in complex surgeries.
Solid organs—adrenal
V023—Retroperitoneoscopic adrenalectomy for a Cushing Syndrome – pitfalls
Teresa Vieira Caroço, Carlos Eduardo Costa Almeida, C.E. Costa Almeida, J. Vilaça
Hospital CUF Coimbra, Surgery, Portugal
Introduction: Cushing's syndrome is characterized by central obesity, “orange on toothpicks”, which can bring additional difficulties to the surgical procedure. The purpose of this video is to highlight the pitfalls of retroperitoneoscopic adrenalectomy in this disease.
Methods: Retroperitoneoscopic adrenalectomy in a patient with a 4.7 cm Cushing's syndrome on the right adrenal.
Results: The huge amount of fat prevents the identification of the upper pole of the kidney, a key landmark for performing retroperitoneoscopic adrenalectomy. Visualization of VCI can also be tricky.
Discussion: The difficulty in identifying the few anatomical landmarks is evident due to the amount of fat that characterizes Cushing's Syndrome. For the success of the treatment, it is important to have a good knowledge of anatomy and to maintain a lateral to medial dissection. Awareness and caution are paramount when identifying the VCI.
Solid organs—adrenal
V024—Laparoscopic trans-abdominal right adrenalectomy for giant adrenal tumor
Maciej Matyja, P. Major, M. Pedziwiatr
Jagiellonian University Medical College, 2nd Department of General Surgery, Poland
Introduction: Laparoscopic adrenalectomy has become a golden standard for most adrenal disorders. It still remains controversial in case of large tumors, where malignancy is suspected. Maintaining the proper oncological technique may be more challenging in laparoscopy, because of a higher risk of tumor capsule injury leading to intraoperative dissemination of cancer cells. However, many proponents of laparoscopy argue that in the hands of an experienced surgeon it can be safely performed.
Aim: The aim of this video is to demonstrate the application of laparoscopic surgery for the treatment of large malignant adrenal tumors. Methods: Patient is a 76 year- old female (BMI of 32,7 kg/m2) with right adrenal incidentaloma 14 cm in diameter, with no hormonal activity. There was no infiltration of surrounding organs, no lymphadenopathy and no distant metastases found preoperatively. The patient was scheduled for laparoscopic right adrenalectomy (lateral transperitoneal approach). After positioning our patient in left lateral decubitus, ports were placed inferior to the costal margin. The right lobe of the liver was mobilized, the inferior vena cava was exposed and dissected. The adrenal vein was identified, dissected, double-clipped, and divided. Laparoscopic ultrasound examination was performed to exclude infiltration of the right kidney's upper pole. The tumor was then dissected circumferentially and was removed without injuring its capsule in an endoscopic retrieval bag. Operative field was once again examined for hemostasis.
Results: Patient tolerated the procedure well, had no issues with hemodynamic stability and her blood pressure was within normal ranges during and following the case. In postoperative period we noted a collection of fluid (6 cm in diameter) above the right kidney's upper pole. No additional intervention was needed. The pathology report confirmed R0 resection of low grade adrenocortical cancer with negative lymph nodes.
Conclusion: Laparoscopic surgery for large adrenal tumors in the hand of an experienced surgeon may be efficient and treated as an alternative to open surgery. Additionally, starting a procedure with laparoscopy allows for minimally invasive evaluation of peritoneal cavity.
Solid organs—adrenal
V241—Laparoscopic left adrenalectomy and resection of extra-adrenal paraganglioma
Maciej Matyja, M. Pedziwiatr, P. Major, A. Matyja
Jagiellonian University Medical College, 2nd Department of General Surgery, Poland
Introduction: Laparoscopic adrenalectomy has become a gold standard for most adrenal disorders including pheochromocytoma. Retroperitoneal paragangliomas are rare tumours arising from neural crest cells located near or in the autonomic nervous system
Aim: The aim of this video is to demonstrate the application of laparoscopic surgery for the treatment of paraganglioma located in retroperitoneal space.
Methods: A 35-year-old man presented to the outpatient department with complaints of paroxysms of headache, sweating and high blood pressure. He was found to have elevated urinary metadrenalines (metanephrines) and a heterogenous lesion (15 mm in diameter) in left adrenal gland on contrast-enhanced computed tomography of the abdomen. Adrenal pheochromocytoma was diagnosed and the patient was scheduled for laparoscopic left adrenalectomy (lateral transperitoneal approach) after stabilization of the blood pressure (doxazosin). Laparoscopy revealed a normal adrenal gland which was resected and an extra-adrenal mass (20 mm in diameter) located in the retroperitoneum.
Results: Postoperatively blood pressure values were normalized. No antihypertensive therapy was needed. Patient was discharged on the first day post-op. Pathology report confirmed the final diagnosis of retroperitoneal paraganglioma and a normal adrenal gland.
Conclusion: There is no doubt that laparoscopy is the most efficient method in adrenalectomy. We should always consider examining the retroperitoneal space after the resection, especially when there are no visible lesions in the adrenal gland.
Solid organs—adrenal
V242—ENDOSCOPIC RETROPERITONEAL LEFT ADRENALECTOMY
Ester Sánchez-Espinel1, J. F. Noguera Aguilar, J Aguirrezabalaga González, L Castro Diez, M.L. García Jiménez, J García Orozco, M Taboada Ameneiro
1Hospital Povisa, General and Digestive Surgery, Hospital Universitario A Coruña, General and Digestive Surgery, Spain
Aims: We present a video about endoscopic retroperitoneal left adrenalectomy and laparoscopic segmentectomy VI-VII.
It is the technique of choice for patients with previous abdominal surgeries and those who need bilateral adrenalectomy.
We show the advantages of the retroperitoneal approach compared to transabdominal approach avoiding to mobilize overlying organs and intra-abdominal adhesions.
Methods: A clinical case is presented, in video format, of a 64-year-old male with a known history of upper rectal adenocarcinoma, diagnosed in 2016, after which he received neoadjuvant chemoradiotherapy, laparoscopic anterior resection of the rectum and adjuvant chemotherapy. After a disease-free interval longer than two years, in 2019 a new lesion was detected in the liver segment V which was suspicious for metastasis, with posterior pathological confirmation after metastasectomy.
In 2020 a left adrenal lesion compatible with metastasis was discovered on a follow-up CT. Further workup with PET-CT was suggestive for malignancy too and pathological pickup was demonstrated on the segment V, concerning for tumour persistence.
The patient was presented in a multidisciplinary committee where endoscopic adrenalectomy and surgical rescue of the hepatic metastasis were opted for.
Results: Endoscopic retroperitoneal left adrenalectomy and laparoscopic segmentectomy VI-VII.
The operative time was 45 min and the second time lasted 150 min.
There were no complications and the patient was discharged twelve days after surgery with good oral intake and correct pain control.
Conclusion: Retroperitoneoscopic adrenalectomy is an alternative minimally invasive approach.
The main disadvantages of retroperitoneal approach are small and no preformed working space and less familiar anatomic relationships.
Tumour size might constitute a relative contraindication since it could prove technically difficult to mobilize and resection.
It is a reproducible technique with a suitable operative time.
Solid organs—Adrenal
V243—Minimally invasive transperitoneal approach for pheochromocytoma surgery – a case report
Rita Canotilho, J.M. Carvas, A.M. Correia, C. Baía, P. Pinto, L. Lencastre, A.P. Santos, I. Azevedo, J. Abreu de Sousa
Instituto Português de Oncologia do Porto, Surgical Oncology, Portugal
Aims: Pheochromocytomas are rare tumours derived from neural crest chromaffin cells. Despite early concerns with the feasibility of the laparoscopic approach for this type of tumours, current evidence shows the safety of the minimally invasive approach in centres with adequate experience. We aim to present a case of a right sided pheochromocytoma, with variant venous anatomy of the adrenal gland, safely managed by laparoscopic transperitoneal approach.
Methods: The authors present a case of laparoscopic lateral transperitoneal right adrenalectomy, following a standardized approach with early venous ligation. The patient had a 28 mm functional pheochromocytoma, with two main adrenal veins draining to the inferior vena cava.
Results: A 56 year-old patient, followed in our Institution since 2018 after a total thyroidectomy and radioactive iodine treatment for papillary cancer, undertook an abdomino-pelvic CT as requested by her primary care physician (for unrelated chronic lumbar pain) revealing a right sided adrenal nodule. Further study with urinary amine measurement and MIBG scintigraphy was compatible with a functioning pheochromocytoma and the patient was proposed for surgical treatment. She was preoperatively treated with phenoxybenzamine.
The patient was positioned in left lateral decubitus, four subcostal trocars were placed and pneumoperitoneum was maintained at 10-12 mmHg. Immediately after insuflation a rise in blood pressure was noted. After retracting the liver cephalad, the lateral side of the inferior vena cava was exposed in an effort of identifying the main adrenal vein. Caution was taken not to grasp the gland directly. Temporary interruption in gland manipulation was needed, as well as intravenous vasodilators to allow hemodynamic stability. Two veins draining to the inferior vena cava were encountered and ligated with Hem-O-Lok® clips – after this procedure no hypertensive/hypotensive episodes were registered. Additional dissection and arterial ligation was performed with LigaSure™ coagulation device. After a 24-h stay in the intensive care unit for monitoring purposes, the post-operative period was uneventful. Definitive histological analysis revealed a pheochromocytoma with a PASS score of 5.
Conclusion: With a multidisciplinary peri-operative evaluation of patients with pheochromocytomas, involving the surgical, anaesthesiological and medical endocrinologist teams, a minimally invasive approach is feasible and safe.
Solid organs—adrenal
V244—Management of bleeding during laparoscopic adrenalectomy
Maciej Matyja, P. Major, M. Pedziwiatr
Jagiellonian University Medical College, 2nd Department of General Surgery, Poland
Introduction: Minimally invasive adrenalectomy has become the gold standard in adrenal surgery. Laparoscopic adrenalectomy with the patient in the lateral decubitus position and transperitoneal approach is worldwide accepted and also a preferred method at our Department. Bleeding as an intraoperative complication may cause difficulties in continuing adrenalectomy via laparoscopy
Aim: The aim of this video is to analyze how to avoid possible intraoperative bleeding in the future and menage this sort of complication after it occurs.
Methods: After positioning our patients in left or right lateral decubitus (depending on the tumor location), ports were placed inferior to the costal margin. The adrenal vein should be identified, dissected, double-clipped, and divided. The adrenal gland is then dissected circumferentially and is removed in the endoscopic retrieval bag. The video shows intraoperative complications that occurred and included venous bleeding
Results: All the presented complications were managed laparoscopically. There was no need for conversion. The patients were discharged on a first or second day post-op after an ultrasound check.
Conclusion: Bleeding during minimally invasive adrenalectomy may be a severe complication especially in a small operative field. Conversion to open surgery significantly influences the rate of postoperative complications, therefore experienced surgeon should be able to menage bleeding laparoscopically but most of all we should know how to avoid it.
Solid organs—adrenal
V245—Retroperitoneoscopic left and right adrenalectomy
Marco Maria Lirici, Andrea Biancucci, A. Biancucci, A. Fassari
"San Giovanni—Addolorata" Hospital Complex, Department of Oncologic Surgery, Italy
Aims: Posterior retroperitoneoscopic adrenalectomy (PRA) is an alternative approach to laparoscopic transperitoneal adrenalectomy (LA), potentially offering less pain and faster recovery. Despite its major advantages, including shorter duration of operation, minimal blood loss and decreased postoperative pain, most surgeons still prefer LA due to the familiar anatomical environment and shorter learning curve (arguable). PRA offers a more direct route to the adrenal glands, without the need to mobilize and dissect adjacent fragile intra-abdominal organs. Other advantages are its feasibility in obese patients and in those with a medical history of abdominal surgery or splenectomy. Furthermore, the posterior approach to adrenalectomy allows to treat both glands without changing the prone position. The video shows the technique of left and right retroperitoneoscopic adrenalectomy in two different cases.
Methods: First case: 42-year severe obese woman with 52 kg/m2 BMI and hypertension. Incidental finding of left adrenal mass at abdominal ultrasonography performed within the bariatric surgery work-up. CT scan showed a 5 cm in diameter lesion suggestive for adrenal adenoma. Second case: 69-year women with history of breast and kidney cancer and chronic lymphatic leukemia. At oncologic follow-up sudden rise of CA-125. Total body CT scan showed a 1.2 cm in diameter lesion of the right lung superior lobe and a 3.5 cm lesion of the right adrenal gland. In either case a 2-port posterior approach was attempted with the patient placed in the prone position. The tip of the 11th and 12th ribs was used to guide the placement of trocars. The working space is created by blunt and sharp dissection of the extraperinephric fat reaching the upper pole of the kidney. After the adrenal gland was detached from the kidney, medial mobilization was completed. Trough this approach the adrenal vein is suddenly visualized on the left side and cauterized. On the right-side this step was facilitated by the exposure of inferior vena cava. The dissection is than completed cranially and ventrally taking care not to damage the peritoneal layer. The specimen was extracted through the first incision site in a retrieval bag.
Result: Operating time was less than 50 min in both cases. Post-operative course was uneventful and both patients were discharged respectively on postoperative day 2 and 3. Hysto-pathologic study showed adrenal adenoma in the obese patient and a clear cell carcinoma with immunohistochemical characterization compatible with lung cancer metastasis in the second patient.
Conclusion: Retroperitoneoscopic adrenalectomy further minimizes the invasiveness of the procedure and may be accomplished through a 2-port approach and even through a single port approach.
Solid organs—gynaecology
V246—Laparoscopic challenge to treat a giant intra-abdominal cyst
Teresa Vieira Caroço1, C.E. Costa Almeida2, H. Louro3, I. Rato4, J. Vilaça5
1Instituto Português de Oncologia de Coimbra, Surgery, 2Universidade de Coimbra, Faculdade de Medicina, 3Centro Hospitalar Vila Nova de Gaia e Espinho, Surgery, 4Centro Hospitalar do Porto, Surgery, 5Hospital da Luz Arrábida, Surgery, Portugal
Introduction: Giant intra-abdominal cysts are rare. They can be originated from the mesentery or the ovarium. However, a preoperative accurate diagnosis is difficult. Although laparoscopic treatment is challenging, it has several advantages. The authors report the use of laparoscopy to resect these entities.
Methods: A female patient complaining of abdominal plethora was diagnosed with a 28 cm intra-abdominal cyst, probably originating from the small bowel mesentery. CT scan and MRI did not reveal any criteria of malignancy. Laparoscopic resection was conducted.
Results: The patient was placed in a Trendelenburg position with split legs, and four trocars were used. Entrance into the peritoneal cavity was accomplished with a blunt tip trocar to avoid inadvertent injury to the giant cyst. To prevent spillage, a balloon trocar was placed inside the cyst and 6 L of clear fluid were aspirated. The cyst was closed with a cerclage suture. Following a complete exploration of the abdominal cavity, the cyst was diagnosed to be from the left ovary. Left oophorectomy was performed, and the entire mass was retrieved inside a bag through a Pfannenstiel incision. The patient was discharged home free of symptoms.
Discussion: Cystic lesions from the mesentery or the ovarium can be malignant. Complete resection without fluid spillage is paramount. The laparoscopic approach allows for safe cystic drainage, and diagnostic confirmation of cyst etiology The minimally invasive approach offers an effective, quick, and painless way to treat giant intra-abdominal cystic lesions.
Solid organs—parathyroid
V076—Simultaneous endoscopic transaxillary thyroidectomy and parathyroidectomy
Jaime Vilaça, C.E. Costa Almeida, S. Graça
Hospital da Luz, Surgery, Portugal
Introduction: Remote endoscopic transaxillary approach to the neck is a valid and available option in thyroid and parathyroid surgery. The demand for this minimally invasive technique by patients, whether women or men, is growing in our practice.
Material and Methods: Video of simultaneous transaxillary approach to multinodular goiter and primary hiperparathytoidism (PHP), with frozen section pathologic examination and iPTH measurement.
A 59-year-old man, hypertensive and diabetic, was referred to our clinic for primary hyperthyroidism (PTH 188 pg / ml, Corrected calcium 11 mg / dl, ultrasound: image compatible with enlarged parathyroid on the left, Tc99-Sestamibi scintigraphy: hyperfixation match with ultrasound image) and multiple nodules in the left thyroid lobe, the largest with 26 mm, benign.
Results: Left hemi-thyroidectomy and ipsilateral transaxillary parathyroidectomy were performed. The surgery was carried out without complications and the patient was discharged asymptomatic on first postoperative day. Frozen section revealed parathyroid tissue and the definitive histological result was parathyroid adenoma and colloid nodular hyperplasia. The iPTH values defined the surgical cure (iPTH0 340, iPTH10 23)—Fig. 1.
Discussion: Transaxillary endoscopic cervical approach is a safe and effective procedure for selected cases of simultaneous treatment of thyroid and parathyroid pathology. This is a clinical case that shows an unusual association of thyroid and parathyroid surgical disease.
Solid organs—spleen
V247—Laparoscopic approach to a post-traumatic pseudocyst splenic in a young female. A case report
Fabio Cavallo, G. Cestaro, M. Zese, D. Prando, F. Agresta
AULSS 5 Polesana—Adria Hospital, General Surgery, Italy
Background: Splenic cysts are not so common in incidence. Only 700-750 cases have been reported till now in the literature. Splenic cysts can be further classified into parasitic and non-parasitic cysts. These are further subdivided into true and false or pseudocyst. Pseudocysts are those who are lacking any epithelial lining and they are usually a result of trauma, infection or infarction.
Case report: We present a case of a young woman 22 years-old which presented at our Department complaining abdominal pain. Laboratory test were all within normal values. No previous abdominal surgery, she referred past sports accident. We performed abdomen TC SCAN revealed a post-traumatic splenic pseudocyst of the estimated volume of about 600 cc. We managed this case with minimally invasive approach with complete preservation of spleen and only removal of pseudocyst. Laparoscopy was performed in general anaesthesia with trocars and optics of 5 mm. Operation duration was 70 min long, pneumoperitoneum pressure was maximum until 10 mmHg. We used radio-frequency device (LigaSure™ Maryland—Medtronic) and haemostatic agent (Floseal®—Baxter) and we finally put abdominal drainage tube. The hospitalization stay was 3 days long. Histological diagnosis confirmed the pseudocyst.
Conclusion: Laparoscopic approach with 5 mm accesses and optics is safe and feasible, overlapping on other techniques, for splenic cysts without increasing costs, average hospitalization days and complication rates. It also allows a better aesthetic result with greater patient satisfaction and faster return to daily activities.
Solid organs—spleen
V248—Laparoscopic splenectomy for giant epithelial cyst of the spleen
Daniel Coronado Llanos, A. Centeno, S. Gonzalez, C. Mühlenberg, R. Ribas, C. Lopez, J. Sala
Hospital Sant Joan Despì Moisès Broggi, General Surgery, Spain
Aims: Splenic cysts are relatively uncommon and often a incidental finding. They are usually asymptomatic, but when they reach large size, the compression of neighboring organs causes several non-specific symptoms. Their treatment varies from partial splenectomy to total splenectomy when there is hilum involvement. This video aims to present a case of a giant splenic cyst and a feasible minimally invasive option for its treatment.
Methods: A 32-year-old woman without past medical history presented with abdominal pain and palpable mass. She was diagnosed of splenic cyst, based on CT scan that report a 14 × 16.5 cm of diameter upper pole lesion with displacement of adjacent organs, with liquid content and no signs of acute complication findings (Fig. 1). CA 19.9 level was 43.7 U/ml. Test for hydatidosis was negative. A laparoscopic access is chosen for its treatment.
Results: Total laparoscopic splenectomy was performed performed without complications, with a short length of hospital stay. The histopathology showed squamous cystic wall lining compatible with epidermoid cyst. Labo¬ratory control at 3 months reported normalization of CA 19-9 level. Radiological findings in CT scan control showed no later complications (Fig. 2).
Conclusion: Laparoscopic splenectomy is still a challenging procedure, more so when the access to the abdominal cavity is hampered by the presence of a giant mass. Minimally invasive treatment of the spleen is feasible in selected cases and should be considered as part of surgical treatment. Total splenectomy is preferred when the splenic cyst is oversized or cannot be excised with safety.
Solid organs—spleen
V249—Laparoscopic partial splenectomy for giant splenic cyst
Anabel García León, Ana Senent Boza, V. Pino Diaz, M. Rubio Manzanares, A. Senent Boza, F.J. Padillo Ruiz, J.M. Martos Martinez
Hospital Universitario Virgen del Rocío, Cirugía General y del aparato digestivo, Spain
Introduction: The better understanding of the importance of the spleen as an important organ of immune system and several post-splenectomy infections, more and more surgeons prefer to parenchyma-preserving surgical procedure. Since the first laparoscopic partial splenectomy reported in 1995 by Uranüs et al., the technique has been in continuous development to become a safe and feasible technique for benign lesions.
Material and method: We present the case of a 19-year-old patient with the incidental diagnosis of a splenic cyst measuring 8.4 × 8.6 cm in the upper portion after admission for a pneumonic process.
The detailed surgical technique is exposed in the video, with the individualized dissection and section of the superior terminal branch of the splenic artery and the consequent delimitation of the viable splenic parenchyma. The splenic transection with bipolar energy and electrocoagulation is visualized with a bleed of 200 ml without the need for transfusion.
Result: Postoperative without complications with doppler ultrasonography carried out 48 h after surgery, which found good flow of the splenic artery and which was confirmed at 6 months later with a functioning splenic remnant.
Conclusions: Laparoscopic partial splenectomy is a safe and feasible technique in selected patients which get anatomical and functional preservation. The development of technology and understanding of the end-vascular distribution of splenic vessels make posible to reduce the risk of intraoperative bleeding.
Solid organs—thyroid
V078—Endoscopic Transoral Videoassisted Isthmectomy—Vestibular Approach
Jaime Vilaça, C.E. Costa Almeida, R. Pereira, S. Graça
Hospital da Luz, Surgery, Portugal
Introduction: In thyroid surgical pathology, the best treatment for the exclusively isthmic disease has always been a controversial subject, specially when it comes to malignant disease. Whenever istmectomy can achieve a complete resection, this may be an appropriate and curative procedure associated with less morbidity.
Material and Methods: A video of transoral endoscopic approach of a thyroid follicular tumor (Bethesda IV) in a single isthmic nodule, is presented.
A 42-year-old man, heavy smoker, with no chronic diseases was referred to our clinic for consultation. He complained of goiter related to a single isthmic nodule of about 3 cm in greater dimensions. Cytological examination revealed FLUS on a first attempt and Follicular Tumor after.
Results: Transoral endoscopic isthmectomy with a vestibular approach was performed. Surgery was carried out without complications and the patient was discharged asymptomatic on first post-operative day. The definitive histology exam was that of follicular adenoma completely removed.
Discussion: A central endoscopic approach to the thyroid can be achieved via the trans oral route. This minimally invasive cervical surgery is a real NOTES approach allowing a great view (Fig. 1), no scar and minimal trauma perceived by the patient. This provides a safe and effective technique for these unusual cases.
SOLID ORGANS—Thyroid
V079—Intraoperative Indocyanine Green Parathyroid Angiography in Transaxillary Endoscopic Thyroidectomy
Paula Dominguez Garijo1, M. Manyalich Blasi1, J. Farguell1, D. Saavedra3, M. Mora2, F. Hanzu2, C. Fondevila1, J. Vilaça4, O. Vidal1
Hospital Clínic of Barcelona, 1General Surgery, 2Endocrinology, 3Consorci Sanitari Alt Penedès Garraf, General Surgery, 4Hospital da Luz Aveiro, General Surgery, Spain
Aims: Postoperative hypoparathyroidism is most common complication after thyroid surgery, related to damage of parathyroid glands (PG) due to mechanical or thermal trauma, devascularization or inadvertent removal. Transaxillary endoscopic thyroidectomy is a safe and feasible alternative to the traditional open surgical approach, offering excellent aesthetic results with no visible scarring in the neck region and enhanced operative visualization. However, as PG identification method is usually based on visual inspection and palpation by the surgeon, endoscopic approach may difficult its preservation. Indocyanine green (ICG) parathyroid angiography has been recently proposed as a tool to evaluate perfusion of PG and a predictor of postoperative hypocalcemia in thyroid surgery. The objective of this case is to show the benefits of the incorporation of indocyanine green angiography in transaxillary endoscopic thyroidectomy for the preservation of the PG.
Methods: A 47-year-old woman was referred for evaluation in the context of increased cervical volume without any associated symptomatology. Blood test showed normal thyroid profile. Cervical ultrasound imaging identified a 3 cm single hypoechogenic nodule with well-defined edges and presence of peripheral vascularization, compatible with TIRADS 4a. Pathological result of Fine needle aspiration biopsy cataloged the lesion as BETHESDA III.
Results: The patient underwent transaxillary endoscopic thyroidectomy. The cervical region was accessed with two axillary and one periareolar entry ports. Dissection begun in the subcutaneous plane, leaving above first the pectoralis major, then the anterior border of the sternocleidomastoid muscle and finally the prethyroid musculature. The lobectomy plus thyroid isthmectomy was completed, preserving the recurrent laryngeal nerve without pulling it, given the lateral access. ICG angiography assessed the identification and preservation of the parathyroid glands. The postoperative period was uneventful, confirming the absence of hypocalcemia in blood test control, and patient was discharged at 24 h after surgery. Final pathology revealed a 3 cm nodule without malignancy.
Conclusions: Indocyanine green angiography in the thyroid surgery allows accurate and real-time assessment of the viability of parathyroid glands, ensuring a successful and secure minimally invasive approach.
SOLID ORGANS—Thyroid
V080—Transaxilar thyroidectomy: trans- ECM approach
Jaime Vilaça, D .Moreira, S. Graça
Hospital da Luz, 1Surgery, 2Anesthesiology, Portugal
Introduction: Transaxillary thyroidectomy is a demanding surgical procedure, which requires a long learning curve, due to its technical challenges, as well as a trained and experienced team in endoscopic surgery.
Material and Methods: A video of a transaxillary thyroidectomy with a technical variance: the approach through the two branches of the ECM muscle.
Results: Demonstration of a change to the transaxillary endoscopic thyroidectomy technique (supra-medial approach to ECM) that arose from the need for better visualization of the recurrent laryngeal nerve (NLR)—Fig. 1 , and the postero-medial region of the thyroid, in a highly experienced working group, with more than 150 transaxillary approaches successfully carried out. The surgical procedure was performed through this gap, allowing a better identification of the structures and a consequent increase in their safety.
Discussion: As the surgical team gains experience, and taking advantage of the anatomical variability of each patient, there may be a need for adjustments to the technique described, in order to improve the procedure and increase its safety.
Upper GI—benign esophageal disorders
V033—Thoracoscopic Excision of an Oesophaegal Duplication Cyst
Maria Alfonso Garcia, N. Pujol Cano, A. Bianchi, J.A. Martínez Córcoles, E. Ferrer Inaebnit, A. Craus Miguel, L. Fernández Vega, S. Jeri Mcfarlene, A. Gil Catalán, X. González Argente, A. Pagán Pomar
Hospital Universitario Son Espases, General Surgery Department, Palma de Mallorca, Spain
Aims: Oesophageal duplication cysts are congenital malformations of the primitive foregut. These rare lesions accounts for 10% of gastrointestinal cysts. They are usually diagnosed during childhood due to clinical manifestations such as dysphagia, retrosternal pain, or respiratory symptoms. Treatment is generally done at paediatric age, since most adults are asymptomatic. Likewise, open or minimally invasive surgery is the gold standard treatment due to the possibility of malignant degeneration. The aim of this video is to illustrate the key steps for the surgical technique of an oesophageal duplication cyst excision through thoracoscopic approach.
Methods: A 35-year-old patient consulted for chest pain during Valsalva manoeuvres. Endoscopy revealed extrinsic oesophageal compression and the oesophagogram showed a repletion defect in the distal oesophagus. A computed tomography (CT) scan showed a oesophageal duplication cyst.
Results: A prono right thoracoscopic approach was used to resect the cyst. Surgical intervention was performed with two 5 mm and two 10 mm laparoscopic trocars placed in the 3rd intercostal space near the midclavicular line, in the 5th intercostal space, anterior to the lower edge of the scapula, in the 7th intercostal space near the midclavicular line and in the 8th intercostal space, respectively. A 30° forward oblique laparoscope was used.
The distal third of the oesophagus had a cystic tumour that was released without any incident by blunt dissection and using bipolar energy. An atraumatic grasper and a laparoscopic swab were used. Special attention was paid in order to avoid injuries to the adjacent structures such as the oesophagus or the lung parenchyma. After resection of the cyst, the oesophageal defect in the muscular layer was sutured by manual continuous suture. The duration of the procedure was 64 min without significant blood loss. After 3 days of admission, the patient evolved favourably and without any postoperative complication (CLAVIEN-DINDO: 0) within the first 30 days.
No persistence of the cyst or presence of oesophageal diverticula was observed during the follow-up in subsequent imaging tests. The histological diagnosis confirmed the clinical suspicion of oesophageal duplication cyst.
Conclusions: Thoracoscopic excision of oesophaegal duplication cysts is surgically feasible, effective and safe. Following our steps, these minimally invasive approach has no significant blood loss, any postoperative complication as well as it also allows a quick recovery with minimum postoperative pain.
Upper GI—benign esophageal disorders
V034—Subcardial leiomyoma: 3D-reconstruction and laparoscopic enucleation
Francisco Moreno-Suero, A. Senent-Boza, I. Alarcón, M.J. Cuevas-López, N. García-Fernández, A. De Jesús, M. Socas-Macías, F. López-Bernal, F.J. Padillo-Ruíz, S. Morales-Conde
Virgen del Rocío University Hospital, General and Digestive Surgery, Spain
Case exposure: A 64-years-old female was diagnosticated of subcardial tumor compatible with leiomyoma as an incidental finding on CT-scan due to acute pancreatitis.
CT-scan showed a gastric wall-dependent soft tissue mass at the level of the esophageal hiatus with neoformative appearance. Echoendoscopy described a 55 mm heterogeneus and hypoecoic subcardial tumor to 35 cm from the dental arch. Pathology report was compatible with leiomyoma
Before surgery, a 3D reconstruction was performed with a computer model in order to assess the relationships of the tumor with nearby structures.
We performed a laparoscopic enucleation of the tumor and lighted esophageal tube-guided surgery. There were no complications. The patient returned home the day after surgery.
Conclusion: 3D reconstruction models are useful for evaluating the patient's anatomy and the relationships of tumors with nearby structures in order to plan surgical interventions.
Upper GI—benign esophageal disorders
V035—Cyanoacrylate for a safer Mesh Fixation during Laparoscopic repair of Morgagni Hernia
Carlos Hoyuela1, S. Guillaumes2, M. Juvany3, N.J. Hidalgo2
1Hospital De Mollet Barcelona, General And Digestive Surgery, 2Hospital Clinic Barcelona, Gastrointestinal Surgery, 3Hospital De Granollers, Surgery, Spain
Aim: To describe the main steps of the laparoscopic mesh augmentation repair of a Morgagni hernia focusing on the atraumatic mesh fixation with cyanoacrylate (CA) that should prevent the potential complications associated with tacks or sutures.
Material and Methods: An 81-year-old obese woman, with multiple comorbidities, presented with frequent episodes of severe chest pain secondary to a big Morgagni hernia containing the omentum and the transverse colon. Surgical Technique: 4 Trocars. Reduction of the hernia contents; the sac was then withdrawn and resected. Hernia defect measure: 6 cm. in width. The defect was then closed with transparietal interrupted 2/0 polyester sutures. No pledgets were necessary due to the lack of tension. The closure was reinforced with a tailored, round-shaped 15 × 15-cm. composite mesh (Dynamesh IPOM®: PVDF + polypropylene).
The mesh was then positioned and atraumatically fixed to the diaphragm with a double crown of cyanoacrylate drops (Glubran ®) instead of tacks or sutures, using the Gluetack® laparoscopic device. No drain was placed.
Results: Operating time: 85 min. No complications were observed. The patient was discharged 48 h later after an uneventful postoperative course and relevant painless (VAS: 2). After 9 months of follow-up, the patient remains asymptomatic and without recurrence on CT scan. The patient satisfaction is high (9/10 score).
Conclusions: Atraumatic fixation of meshes to the diaphragm using cyanoacrylate should be considered a safer alternative to traumatic fixation methods such as tacks or sutures when repairing a Morgagni hernia.
Upper GI—benign esophageal disorders
V036—Hybrid technique in colon interposition for esophageal replacement using indocyanine green (ICG) fluorescence imaging
Paula Muñoz, Pablo Priego Jiménez, J. Núñez, E. Payno, D. López, L. Blázquez, M. Cuadrado, S. Sánchez, J.M. Fernández, J. Galindo
Hospital Universitario Ramón y Cajal, General and Digestive Surgery, Spain
Aims: Colonic interposition with esophagectomy is the surgery of choice in the treatment of esophageal stricture secondary to caustic esophagitis. Gastric pull-up may be a safe option in these patients, however strictures very close to the pharynx or the injury of gastric mucosa itself limit its use in this type of patients. The main risk of colonic interposition is anastomotic leak, with rates of up to 30%, related to an increased number of anastomosis and inadequate perfusion of the anastomoses or the colonic conduit.
Methds: We present a video of an hybrid approach for an esophagus-gastrectomy with isoperistaltic transverse coloplasty, performed by thoracoscopy (thoracic esophagectomy), cervicotomy and midline laparotomy, in a patient with 2 years history of esophageal stricture secondary to caustic injury resistant to endoscopic treatment who required a jejunal feeding catheter for nourishing. Prior to surgery, the stomach couldn’t be evaluated due to the impossibility of endoscopic passage.
Surgery was carried out under laryngeal nerve monitoring, and with ICG fluorescence imaging PINPOINT Endoscopic Fluorescence Imaging System to evaluate colonic perfusion.
Results: The cervical esophagus was sectioned 2 cm proximal to the stenosis at the level of the cricoid cartilage. Gastroplasty was ruled out, because an intraoperative endoscopy showed severe antral stenosis and mucosal alterations, and gastrectomy was performed. Finally, a left colic artery-dependent transverse isoperistaltic coloplasty was performed with Roux-en-Y colojejunal reconstruction that demonstrated adequate perfusion with ICG.
Conclusion: Endoscopic evaluation of the stomach is essential to consider the gastric plasty as the reconstructive option. In the presence of insurmountable esophageal stenosis, it should be performed intraoperatively. Colon interposition is the preferred conduit for esophageal replacement when the stomach can’t be used. Multiple interventions have been developed over the years to reduce the rate of anastomotic leak following coloplasty to avoid ischemic complications. ICG fluorescence provides the surgeon with real-time perfusion assessment of a target organ or anastomosis.
Upper GI—benign esophageal disorders
V159—Laparoscopic Repair of an Spontaneous Esophageal Rupture with Concomitant Hiatal Hernia
Carmen Maillo-Oliva1, R. Camacho-Abreu1, J. Lança2, R. Lopes3, N. Candeias1, I. Claro5, J. Sacadura-Fonseca1, M.J. Oliveira1
Hospital Lusíadas Lisboa, 1General Surgery, 2Anesthesiology, 3Radiology, 4Intensive Care, 5Gastroenterology, Portugal
Introduction: Spontaneous ruptura of the esophagus is usually a catastrophic event followed by life-threatening complications with. mortality rate up to 50%. Asymptomatic paraesophageal hernias have a risk of progression to symptomatic hernias of 14% per year, though the risks of symptoms requiring emergency surgery is no more than 2% per year.
Clinical Case: 78 years old man with antecedents of gastro-esophageal reflux, arterial hypertension and benign prostate hyperplasia. He complains of acute epigastric and back pain after dinner. Rx and CT scan were performed confirming a paraesophageal time III hernia with the perforation of the gastro-esophageal junction with pneumomediastinum and mediastinal abcess. A laparoscopic approach was performed 15 h after the beginning of the symptoms. The perforation was repaired with primary suture and Toupet fundoplication was performed. There was an important contamination of the mediastinum. The video shows how the perforation can be managed laparoscopically and the complete treatment of the mediastinal contamination. Control pos-operative CT scan and endoscopy are shown. The patient was discharged 15 days after surgery with normal oral intake.
Conclusion: The diagnosis of esophageal perforation can be made by CT scan with oral contrast. Esophageal perforation with mediastinitis must be treated surgically in the first 24 h to control the sepsis. Laparoscopic approach is excellent for the surgical treatment because esophageal repair can be made safely, mediastinal contamination can be well treated and the inflammatory response of the surgical aggression is lower than with open surgery. Thoracic function can be better preserved if we avoid a laparotomy.
Upper GI—benign esophageal disorders
V160—Thoracoscopic Resection of Esophageal Diverticulum assisted by white light under ICG (Indocyanine Green) Mode
Eugenio Licardie1, A. Baeza-Carrion2, M. Socas2, F. Lopez-Bernal2, I. Alarcón-Del Agua2, S. Morales-Conde2.
1Quironsalud Sagrado Corazón, Unit of Innovation in Minimally Invasive Surgery, Department of General and Digestive Surgery, 2University Hospital Virgen del Rocio, Unit of innovation in Minimally Invasive Surgery And Unit of General and Digestive Surgery, Seville, Spain
Aims: Diverticulum of the lower third of the esophagus could be approach through abdomen or the thoracic cavity. Most of the groups preferred the abdominal approach by laparoscopic even that some time the location is higher than expected being the access a challenge for surgeons. Under specific circumstances the thoracic approach could be useful. Specially in those diverticulum located in the upper part of the lower third or after a complication since adhesion to surrounded structure could add difficulties to the abdominal approach. On the other hand, we have developed an interesting way to control the lumen of the esophagus during the dissection avoiding a perforation.
Methods: We present a case of a 49-year-old female patient with a history of recurrent dyspepsia and respiratory infections secondary due to a large esophageal diverticulum at the upper part of the lower third of the esophagus. The patient was admitted at the hospital six month prior to surgery with an infection and inflammatory process around the diverticulum being treated with conservative treatment and a feeding naso-duodenal tube.
Under prone position the thoracic cavity was approach using three trocars. The diverticulum showed firm adhesion to the lung which were dissected. An orogastric tube with white light was inserted and the ICG mode of the laparoscopic unit was used to see the white light in green, what was useful to control the esophagus. Once the neck of the diverticulum was dissected, a myotomy was performed under the control of the green light. The diverticulum was transected using a 60 mm endostapler. ICG diluted was introduced through the tube to guarantee that there was no leak. At the end of the procedure an intraoperative endoscopy was performed.
Results: Patient was discharged at day three, being asymptomatic after 6 months of follow-up.
Conclusion: In certain cases, thoracoscopic approach in prone position of an esophageal diverticulum is a safe and effective procedure. New technologies, such as ICG mode could be useful to control the esophagus an avoid perforation and other complications.
Upper GI—esophageal cancer
V025—Laparoscopic 2 stage Ivor Lewis meso-oesophagectomy: Hiatal and thoracoscopic infra-azygous dissection for lower oesophageal and junctional adenocarcinoma
Pradeep Veerabhadra Patil
Ninewells hospital and medical school, UpperGI surgery, United Kingdom
Lower oesophageal and junctional adenocarcinomas account for majority of oesophageal cancers in western Europe with the highest incidence in the Netherlands and the United Kingdom. One of the major goals of surgical treatment is to achieve a resection with no tumour at the circumferential or longitudinal resection margins (R0).
We demonstrate our technique of radical meso-oesophageal resection following neoadjuvant chemotherapy. The lack of neoadjuvant radiotherapy makes dissection easier but necessitates a more radical resection.
The concept of meso-oesophageal dissection aims to stay outside the embryological layers which involves dissection of and sometimes including surrounding structures with the aim of not visualising the tumour or oesophagus at all.
Hiatal dissection steps include
Exposure of the hiatus
Superior hiatal dissection and skeletonization of the pericardium which will include the infra cardiac bursa.
En-bloc dissection inclusive of a cuff of the right crus of diaphragm extending to include the right pleura. This involves division of the inferior pulmonary ligament at this stage.
Similar En-bloc dissection on the left side extended to include the left pleura and separation of the left inferior pulmonary ligament.
Skeletonization of the Aorta
Hiatal control of the thoracic duct.
Right side thoracoscopic steps with patient in prone position and surgeon and team standing on right side of the patient include
Identification of the azygous vein, right bronchus and extent of the hiatal dissection
The azygous vein is skeletonized making sure not to injure the right bronchial artery before division.
The pleural is opened adjacent to the lung edge between the site of the inferior pulmonary ligament and the right bronchus to expose the right inferior pulmonary vein. The peri meso-oesophageal fascia is stripped away from the pericardium towards the specimen. This layer should be clearly defined and is then easily extended to skeletonize the pericardial sac and extending across over the left atrium to the left inferior pulmonary veins.
The pleura on the azygous vein is opened to identify the thoracic duct and aorta. The Aorto-oesophageal ligament dissection is kept on the aorta and includes the thoracic duct with the specimen.
The extensive hiatal dissection and inclusion of the right and left pleurae makes completion of this phase relatively easy.
The thoracic duct can be controlled now if not done earlier.
The right bronchus is dissected next and the vagus is divided after preserving the bronchial branch.
All carinal lymph nodes are resected, and the left bronchus and lower membranous trachea are skeletonised.
The left vagus is divided at or just cranial to the left bronchus in the aorto-pulmonary window.
The oesophagus is divided at or just cranial to the divided azygous vein.
The aim of this radical resection is to increase our R0 resection rate to 90% or more.
Upper GI—esophageal cancer
V026—Laparoscopic diaphragmatic hernioplasty after transhiatal-laparotomy esophagectomy
Maria Gallego Gotor, J. Ye Zhou, S. Fernandez-Ananin, E. Ballester Vazquez, L. Cambeiro Cabre, C. Balague Ponz
Hospital de Sant Pau i la Santa Creu, Cirugia General y del Aparato Digestivo, Spain
Objectives: Diaphragmatic hernia after esophagectomy is an infrequent but relevant complication, given the impact on morbidity and mortality that it represents.
Its origin is due to the alteration of the diaphragmatic hiatus during esophagectomy, and the increase in its incidence is considered linked to a greater application of the laparoscopic technique and to increased survival.
The diagnosis occurs in oncological controls either by the appearance of respiratory or digestive symptoms in the form of dysphagia or occlusion.
Material and methods: We present the case of a 58-year-old man, who in December 2009 was diagnosed with esophageal adenocarcinoma in the lower third, T2N1M0, for which he underwent transhiatal esophagectomy by laparotomy after receiving neoadjuvant treatment.
In 2015, he was discharged from the oncology service after a complete remission was considered. In January 2020, he consulted due to symptoms of dyspnoea and chest tightness, which is why a thoracoabdominal CT scan was performed, which revealed a diaphragmatic hernia with contents of the transverse colon and omentum.
It was intervened laparoscopically, dissecting the hernial sac and closing the diaphragmatic defect with Ethibon 2/0 stitches and placement of Bio-A Mesh, fixed with ethibon stitches and GlueBran. The closure of the hiatus is carried out on demand, avoiding its tension. Blake # 19 drain is placed in hiatus.
Results: The patient is discharged on the third postoperative day, without immediate complications.
Conclusions: The open approach to performing an esophagectomy did not contraindicate the laparoscopic approach to the diaphragmatic hernia presented later.
Upper GI—esophageal cancer
V027—ICG-guided lymphadenectomy during minimally invasive Ivor-Lewis esophagectomy in prone position
Noelia García-Fernández, Ana Senent-Boza, A. Senent-Boza, I.Alarcón del Agua, M. Socas-Macías, F. López-Bernal, F. Moreno-Sueros, S. Morales-Conde
Hospital Universitario Virgen del Rocio, Cirugía General y del Aparato Digestivo, Spain
Introduction: The only curative treatment for resectable esophageal cancer is an esophagectomy that associates a lymphadenectomy of the drainage territories. Minimally invasive surgery is associated with better postoperative outcomes and there is a current trend to perform the thoracic stage in prone position in order to reduce pulmonary complications. More extensive lymphadenectomies are associated with greater survival, but also with higher morbidity, so that there is no clear consensus regarding the appropriate extension of the lymphadenectomy.
Material and methods: We report the case of a 71-year-old man with overweight and obstructive sleep apnea syndrome (OSAS), diagnosed with Barrett's esophagus and adenocarcinoma of the distal esophagus that was staged by endoscopic ultrasound, CT and PET as a T1bN0M0 tumor.
Results: The patient underwent a minimally invasive Ivor-Lewis esophagectomy, combining laparoscopic approach and right prone thoracoscopy. The day before surgery, indocyanine green (ICG) was administered by endoscopic injection in the peritumoral submucosa.
During the abdominal stage, an ICG-guided lymphadenectomy was performed, visualizing ICG uptake in the lymph nodes of stations 1 and 2 (right and left cardiac nodes), 7 (along the left gastric artery), 11 (splenic artery) and 112 (para-aortic nodes). No ICG uptake was observed in stations 4-6 (gastro-epiploic artery), 8 (common hepatic artery) or 12 (hepato-duodenal ligament).
The use of the ICG was especially helpful to extend the lymph node dissection to the territory of distal splenic artery and to delimit the dissection point between the territory of left gastric and hepatic arteries and the base of the left gastric artery.
Conventional not-ICG-guided periesophageal, periaortic and subcarinal lymphadenectomy was performed during the thoracic stage due to the previuos intraoperative use of ICG to assess the gastric conduit perfusion during the abdominal stage.
The pathologist reported a T1b adenocarcinoma with negative resection margins. A total of 26 nodes were harvested, all of them free of disease.
Conclusions: In patients with resectable adenocarcinoma of distal esophagus, the use of ICG constitutes a safe and feasible technique, that may ease and guide the lymphadenectomy and, in the future, even modify the type of lymphadenectomy depending on tumor type and location.
Upper GI—esophageal cancer
V028—Hand- assisted Transhiatal Laparoscopic Esophagectomy for Adenocarcinoma of the Esophagus
Alba Gª Chiloeches, Pablo Priego Jiménez, L.D. Juez Sáez, A Santana Valenciano, M. Cuadrado Ayuso, L.A. Blázquez Hernando, S. Sánchez Picot, A. Puerta Vicente, J. Galindo Álvarez, J.M. Fernández Cebrián
Ramon y Cajal Universitary Hospital, Division of Esophagogastric and Bariatric Surgery, Spain
Aim: Transhiatal esophagectomy is recommended for early esophageal cancers of the middle (below the level of the carina) and lower third of esophagus but also in patients who are not fit to undergo a thoracotomy. In order to help to palpate and bluntly dissect tissues, surgeons have begun to utilize devices which allow the surgeon's hand to be inserted into the abdomen during laparoscopic procedures. In this video we describe our surgical technique of hand-assisted transhiatal laparoscopic esophagectomy (HATLE).
Materials and method: A 60-year-old male was admitted to our hospital with an esophageal adenocarcinoma (T3N0) located on the distal part of the esophagus. After neoadjuvant chemoradiotherapy treatment with CROSS regimen, and due to the severe cardiopulmonary comorbidities, a HATLE was performed.
The isolation of the gastroesophageal junction, the stomach mobilization, the descending of the right angle of the colon, the kocher maneuver and the beginning of the transhiatal dissection was carried out using a standard laparoscopic approach. A simultaneous dissection of the proximal esophagus was performed. After that, and facilitated by the use of the surgeon's hand through a handport, a blunt dissection of the esophagus through the hiatus was then carried out. The stomach and esophagus were then withdrawn through the wound of the abdomen, and the gastric conduit was created open. Finally, the procedure was finished with a cervical esophagogastric anastomosis in the neck.
Results: A postoperative cervical leak was diagnosis and treated conservatively. Patient discharge home after thirty days of hospitalization. Finally, pathology analysis showed a poorly differentiated adenocarcinoma ypT3 ypN0 (0/27).
Conclusion: Hand-assisted transhiatal laparoscopic esophagectomy is feasible performed in cases of distal esophagus adenocarcinoma in unfit patients due to severe cardiopulmonary comorbidities.
Upper GI—esophageal cancer
V029—Ten tips and tricks for creation of gastric conduit during three-stage minimally invasive esophagectomy
Luz Juez, P. Pable, M. Bajawi, V. Vaello, R. Arranz, M. Cuadrado, J. Galindo, J.M. Fernández Cebrián
Ramon y Cajal University Hospital, General Division, Spain
Introduction: Esophagectomy is a major surgical procedure associated with a significant risk of morbidity and mortality. The implementation of minimally invasive esophagectomy (MIE) is technically demanding and requires a significant learning curve. In the present video, we describe 10 tips and tricks for creation of a perfect gastric conduit during the abdominal approach in a three-stage MIE. Special issue is focused on the use of indocyanine green (ICG) for checking the vascularization of the gastric conduit.
Materials and method: A 58-year-old female was admitted to our hospital with a diagnosis of advanced esophageal cancer (T3N1) located in the thoracic upper part of the esophagus. After neoadjuvant chemoradiotherapy treatment with CROSS regimen, a radical three-stage (Mc Kewon) MIE was performed.
Results: In our opinion, the 10 tips and tricks that we consider useful in order to create a perfect gastric conduit during MIE are:
The stomach is completely mobilize with and adequate manipulation of the right gastroepiploic artery.
Correct descending of right hepatic angle of the colon.
Wide Kocher maneuver.
Adequate release of medium colic vessels.
Pyloroplasty.
The stomach is then tubularized with a 45 mm stapler (blue cartridge), not protected and from left trocar.
Use of IGC for checking the vascularization of the gastric conduit. (Image 1)
Ascending totally the greater omentum to the chest.
Ascending the pyloroplasty to the esophageal hiatus.
Fixing of the gastric conduit to the right pillar of the diaphragm.
Conclusion: The MIE is safe and feasible for treatment of esophageal cancer but requires a significant learning curve. We describe 10 tips and tricks that are useful for creation of a perfect gastric conduit. ICG fluorescence angiography can be a useful resource to ensure gastric perfusion and help us in the decision of the anastomosis site.
Upper GI—esophageal cancer
V030—Our initial experience in totally robotic esophaguectomy type Ivor-Lewis
Mª Asunción Acosta Mérida, A. Suárez Cabrera, C. Fernández Quesada, J.A. Casimiro Pérez, O. Benet Muñoz, J. Marchena Gómez
Hospital universitario Doctor Negrin, Esophagogastric Surgery, Spain
Aims: To describe the surgical technique and the result of totally robotic minimally invasive esophagectomy ( T-RAMIE) type ivor-lewis in both the thoracic and abdominal cavities.
Methods: We present the case of a 65-year-old man, a smoker of 2 packs a day and chronic obstructive pulmonar disease. Assessed with progressive solid and liquid dysphagia and constitutional syndrome. A study is performed with diagnosis of adenocarcinoma of the esophagus Siewert II cT3NxM0. Neoadjuvant chemotherapy is decided, after which a partial radiological response is observed. Subsequently, Ivor-lewys T-RAMIE is performed. We used a four-arm technique with Xi Davinci for both, the thoracic and abdominal procedures. We start por abdominal procedure in supine position and for the thoracic procedure, the patient was placed in the prone position. Manual esophagogastric anastomosis was performed and the specimen was then removed through a small enlargement of one of the trocars. Jejunnostomy was not performed.
Results: The patient presented a favorable evolution. He began to mobilize on the first postoperative day (POD) and to tolerate oral diet on the 2nd POD. After radiological verification of the integrity of the anastomosis, he was discharged on the 8th day PO without surgical or medical complications. In the pathological anatomy result, we obtained 34 lymph nodes, none of them had metastatic involvement.
Conclusion: Our transition from the conventional laparoscopic approach to the hybrid robotic and finally to totally robotic has been fast, safe and very satisfactory from the technical point of view and in terms of the clinical results on the patients. In a lack of consolidation due to large future studies, we consider that robotics is a further step forward in the implementation of minimally invasive esophageal surgery.
Upper GI—esophageal cancer
V077—Minimally Invasive Cervical Esophagectomy (MICE), radical esophagectomy and 3-field lymphadenectomy without thoracic access
Bastiaan Klarenbeek1, A. Shiozaki2, H. Fujiwara2, C. Rosman1
1 Radboud University Medical Center, Surgery, The Netherlands. 2 Kyoto Prefectural University of Medicine Hospital, Surgery, Japan
Background: Radical esophagectomy combined with two field lymph node dissection is the cornerstone for curative treatment of esophageal cancer. Despite the employment of minimally invasive transthoracic approaches, pulmonary complications remain high (30%).
MICE is an innovative Japanese surgical technique, combining a laparoscopic transhiatal and a single port cervical mediastinal dissection in patients operated for esophageal cancer. It aims to reduce pulmonary morbidity without compromising oncological radicality by avoiding thoracic access, prevailing pleural integrity and facilitating cervical or abdominal instead of pleural drainage of mediastinal infections in case of anastomotic leakage. Potential drawbacks may be an increased incidence of recurrent laryngeal nerve injury and learning associated morbidity.
Methods: In order to explore the feasibility and safe implementation of the MICE procedure in Dutch esophageal cancer patients, we commit to the IDEAL-framework and the Dutch guideline for ‘Introduction of new innovations into clinical practice’.
Results: The ‘Preclinical’ stage consists of 1) site visits to KPUMH Kyoto; 2) protocol development and mini review; 3) human cadaver training and development of virtual supervision platform due to COVID; 4) patient and expert evaluation, prospective risk assessment. In the ‘First in human’ stage, the first five MICE procedures in esophageal cancer patients in the Radboudumc have been performed. Currently, we are in stage 2A ‘Development’, building a single center prospective cohort and finetuning the surgical technique.
Conclusion: MICE is a novel minimally invasive surgical technique, enabling radical esophagectomy and 3-field lymphadenectomy without thoracic access. Thorough preparation in the ‘Preclinical’ stage of the IDEAL framework, leads to successful and safe implementation of the MICE procedure. We would like to present a video with our surgical technique and initial results.
Upper GI—esophageal cancer
V081—Fluorescent lymphography for thoracic duct identification: initial experience of a simplified and feasible ICG administration
Giuseppe Barbato, C. Agostini, L. Fortuna, A. Bottari, G. Braccini, F. Coratti, F. Staderini, F. Cianchi
AOU Careggi, Gastrointestinal surgery department, Italy
Chylothorax refers to the presence of lymphatic fluid in the pleural space secondary to leakage from the thoracic duct (TD) or one of its main tributaries, with a prevalence about 0.6-4%1–7. Indocyanine green (ICG) lymphography can be performed to obtain real-time fluorescent images of the lymphatic flow, which can be useful in identifying the TD and a chyle leak8,9
The injection of ICG into the inguinal nodes is Ultrasound-guided, so it is safe since the structures near to inguinal nodes can be well visualized and so avoided10,11. This study aim to evaluate the efficacy and safety of subcutaneous administration of ICG to obtain a fluorescence lymphography to identify the TD and detect any possible intraoperative chyle fistula for patients undergoing esophageal surgery.
We propose a simplified ICG administration to identify TD during minimally invasive esophagectomy and using near infrared fluorescence (NIR).
Material and methods: Patients unfit for surgery, distant metastasis, and allergic hypersensitivity to ICG was excluded. ICG was diluted in 10 ml of sterile water, and according to the patient's weight, 0.5 mg/Kg was injected bilaterally subcutaneously in the inguinal region 14-16 h before surgery with 25G needle.
Results: We enrolled 14 patients from October 2019 to May 2020. No adverse reactions or iatrogenic lesions at the injection site were observed. The TD is immediately visualized at the beginning of thoracic time in every case considered. and preventively ligated. No aberrant TD was visualized. In one patient was immediately identified and fixed an intraoperative leak of the TD despite having been ligated.
Conclusions: In our initial experience, the procedure was easy to perform, did not require specifically trained staff, not time-demanding, had comparable results to the procedure performed under ultrasound guide. It had also utility for identifying an eventual site of TD injury with chyle leak intraoperatively and confirm the repair was successful. Simplifying the procedure could increase the diffusion of the method and incorporate into routine practice.

Upper GI—esophageal cancer
V250—Hierarchical decomposition and demonstration of the major steps of Linear stapled Thoracoscopic Oesophago-gastric anastomosis
Pradeep Veerabhadra Patil
Ninewells hospital and medical school, UpperGI surgery, United Kingdom
Laparoscopic/Robotic oesophago-gastric anastomosis after Ivor Lewis oesophagectomy can be accomplished by a variety of techniques. Our laparoscopic technique is identical to our open technique that had been modified and improved over 10 years. Hierarchical breakdown of the steps enabled us to transfer the open surgical steps to laparoscopic surgery. The steps can be further broken down into sub steps or tasks (not detailed here) which we use for lab-based training.
This video demonstrates a thoracoscopic linear stapled Oesophago-gastric anastomosis and closure of the stapler entry defect in 2 layers with barbed suture. We think one of the important learning points of our technique is to make the oesophagotomy at least 1 cm away from the stapled end of the remnant oesophagus.
The patient is supine with single lung ventilation and the surgeon and team stand on the right side of the patient.
Stay sutures are placed at the 2 edges of the staple line on the oesophageal remnant. These are used to manoeuvre the oesophagus and help to minimise trauma to the oesophagus by instrument.
Oesophagotomy is made 1 cm distal to staple line. Luminal entry is confirmed, and the opening stretched with a grasper.
The gastrotomy is made 3-4 cm from the end of the gastric tube and similar stretching with a grasper helps easy introduction of the bulky staplers.
A linear stapler with closed staple height of 1.5 mm (Blue colour in the video) is used and only 20 mm to 30 mm ( 2-3 cm) is inserted inside both lumens to keep the anastomosis small.
Care is taken to approximate the luminal edges of the two structures as this helps to keep the stapler entry defect tiny as shown in the video.
The naso gastric (NG) tube is passed beyond the anastomosis into the gastric tube.
The staple-line to staple line technique is used to close the stapler defect in 2 layers. Separate sutures are started at each end to ensure the edges are safely approximated and can be tied at the centre of the defect.
The first layer includes all layers of the gastric wall and all layers of the oesophageal wall away from the stapled end.
The second layer reinforces the first layer and most importantly includes the stapled end of the oesophagus eliminating any weak spots.
Finally, the anastomosis is wrapped with omentum.
This patient had oral fluids from the evening of the operation. The oral intake was gradually increased over the next few days. The NG tube was removed on day 4 and the patient was discharged on day 7 with a plan to gradually introduce solid food over the next 4 weeks.
Upper GI—gastric cancer
V104—95% gastrectomy laparoscopic approach after a Billroth I procedure
Bakarne Ugarte-Sierra, Irune Vicente Rodríguez, N. Ortega Machón, R.A. Abad Alonso, R. Maniega Al, F.J. Ibáñez Aguirre
Hospital Universitario De Galdakao, General Surgery, Spain
Aim: Show a 95% gastrectomy laparoscopic approach after a Billroth I procedure
Methods: description of technique in video presentation
Results: We show the 95% gastrectomy laparoscopic procedure in a patient who suffered a gastric adenocarcinoma in the anastomosis of a previous Billroth I gastrectomy
COnclusions: 95% gastrectomy is a feasible procedure in selected cases
Upper GI—gastric cancer
V105—Gastrectomy in a patient with an aberrrant hepatic artery
Miguel Rocha Melo Dias, M. Pereira, J. Oliveira, C. Velez, R. Lima, J. Bolota, S. Leandro, M. Cotovio, M. Carvalho, J. Caravana
Hospital Espírito Santo de Évora, General Surgery, Portugal
In about 25% of indviduals, part or all of the liver is supplied by an aberrant artery. The aberrant right hepatic artery arising from the superior mesenteric artery is the most common variation. In this case, we present a rarer version of this anatomical variation: the comomon hepatic artery arises from the superior mesenteric artery (Michels classification type IX). This was an incidental finding during lymphadenectomy for gastric cancer.
Upper GI—gastric cancer
V106—Subtotal gastrectomy with D2 lymphadenectomy, step-by-step robotic technique
Helena Salvador-Roses, Fulthon-Frank Vela-Polanco, A Escartín-Arias, M González-Duaigües, P Muriel-Álvarez, J Jara-Quezada, F-F Vela-Polanco, J.J Olsina-Kissler
University Hospital Arnau de Vilanova, HBP-EG Surgery, Spain
Aims: The aim of the video is to show a standardized robotic subtotal gastrectomy with D2 lymphadenectomy.
Methods: The video evaluates the surgical steps of robotic subtotal gastrectomy with D2 lymphadenectomy.
Results: A 70-year-old male patient presented with asthenia and weight loss over 6 months. An endoscopy of the upper gastrointestinal tract (EGD) revealed a erythematous, retracted, and ulcerated antrum. Biopsy revealed a gastric adenocarcinoma. Staging CT-scan imaging studies revealed no lymph nodes nor sites of metastasis. The patient was diagnosed with stage II gastric adenocarcinoma and it was decided to perform a robotic subtotal gastrectomy with D2 lymphadenectomy. The operation time was 260 min. No further evidence of intra-abdominal disease or liver involvement was observed. The patient was discharged home on postoperative day 5 without complications.
Conclusions: Viewing the video can help surgeons training in robotic surgery to perform this technique in a systematic way.
Upper GI—gastric cancer
V107—Robot assisted sub-total gastrectomy for cancer with full-robotic hand-sewn anastomoses
Matteo Palmeri, N. Furbetta, G. Di Franco, S. Guadagni, D. Gianardi, M. Bianchini, A. Comandatore, M. Picchi, L.M. Fatucchi, M. Ginesini, V. Pucci, G. Di Candio, L. Morelli
University of Pisa, General Surgery Unit, Department of Surgery, Translational Research and New Technologies in Medicine, Italy
Aims: Minimally invasive techniques have gradually come to take a leading position in the surgical treatment of gastrointestinal malignancies. We are presenting a case of a gastric adenocarcinoma treated with a full robotic sub-total gastrectomy with D2 lymphadenectomy using the da Vinci Xi platform.
Methods: A 45-years old woman with a finding of an adenocarcinoma of the antrum/greater curvature of the stomach underwent a full robotic sub-total gastrectomy. Patient was placed in lithotomic position and robotic trocars were placed on the transverse umbilical line. Robotic instruments used were monopolar scissors, maryland bipolar forceps, prograsp forceps, Vessel Sealer Extend and the robotic linear stapler.
Results: The procedure was successfully completed in 430 min. The use of the fully wristed Vessel Sealer Extend makes easier difficult maneuvers such as the lymphadenectomy, enabling an optimized approach for vessels sealing and cutting and tissue bundles. In the reconstructive phase of the procedure, hand-sewn gastroenterostomy and enteroenterostomy were performed with double layer of 3-0 V-lok. There were no surgical complications and no intraoperative blood loss. The post-operative course was uneventful and the patient was discharged on the 9th POD. The histological examination of the specimen revealed an adenocarcinoma T1bN0, with 31 negative lymph nodes harvested.
Conclusion: Robotic technique has been proven to be safe and feasible for use in gastric cancer surgery. Moreover, with the advancement of robotic technology, treatment could improve the quality of lymph node dissection.
Upper GI—gastric cancer
V108—Evolution of the laparoscopic oesophagojejunal anastomosis, towards totally intracorporeal technique simplification
Gabriela Rojas-de la Serna, M.L .Herrero-Bogajo, A. Morandeira-Rivas, M.A. Corral-Sánchez, A. López-Sánchez, J. Riquelme-Gaona, J. F. Cuevas-Toledano, E. Fernández Menor de Santos, C. Moreno-Sanz
La Mancha Centro General Hospital, General Surgery and Digestive system, Spain
Aims: Laparoscopic oesophagojejunal anastomosis is considered a very demanding surgical manoeuvre, this being the cause of its scare universalization. Among the different reconstruction techniques, linear side-to-side anastomosis has shown lower morbidity when compared to the circular end-to-side anastomosis, both in terms of dehiscence (4.7% vs 1.1%) and stenosis (8.3% vs 1.8%). Different factors such as abdominal oesophagus length, the diameter of the oesophageal and jejunal lumens, and height of the patient, have to be considered and can influence the decision about the type of anastomosis to be performed. In this video, we depict the evolution of the oesophagojejunal anastomosis after total laparoscopic gastrectomy at our centre.
Methods: Technical details of the consecutive modifications adopted at our centre, for the reconstruction after total laparoscopic gastrectomy, during the last 15 years are presented step-by-step and discussed with the different techniques reported in the literature.
Results: Five different strategies for the laparoscopic oesophagojejunal anastomosis are shown: 1. Circular end-to-side anastomosis with the stapler inserted through a left upper quadrant assistant incision; 2. Fully intracorporeal circular end-to-side anastomosis, dilating the left upper quadrant trocar site to introduce the stapler; 3. Linear stapler side-to-side anastomosis using the overlap method in the left side of the abdominal oesophagus; 4. Linear stapler side-to-side anastomosis using the overlap method in the posterior wall of the abdominal oesophagus with migration of the anvyl folk to the submucosal layer; 5. Linear stapler side-to-side anastomosis using the overlap method in the posterior wall of the abdominal oesophagus under the guidance of a 36-Fr Faucher bougie.
Conclusion: The standardization and simplification of the laparoscopic oesophagojejunal anastomosis reduces its variability and makes it extensible to the majority of esophagogastric surgery units. Fully intracorporeal side-to-side linear stapled anastomosis, with the help of a Faucher bougie, is a feasible and safe option for the reconstruction of the intestinal continuity after total laparoscopic gastrectomy. It offers great stability at the time of oesophagojejunal assembly. Other patient-dependent factors, such as the length of the abdominal oesophagus when choosing the anastomosis technique should be further studied.
Upper GI—gastric cancer
V109—Six indocyanine green fluorescence uses during a D2-total gastrectomy
Cesar Ginesta, G. Cardenas, R. Diaz del Gobbo, I. Fornaguera, M. Valentini
Hopital HM Delfos Barcelona/Hospital Clinic de Barcelona, Upper GI, Spain
Aims: The aim of this video is to show six functions of Indocyanine Green (ICG) during a total D2 – gastrectomy.
MethodsS: We present two cases of laparoscopic total gastrectomy with D2 lymphadenectomy after neoadjuvant treatment, the first one received FOLFOX6 and the second FLOT. Two hours before the intervention, the lesion was endoscopically marked proximally and distally with 0.3 cc of ICG. After lymphadenectomy, 25 mg of ICG were intravenously administered to assess the perfusion of the esophagojejunostomy and duodenal stump. Finally, the surgical specimen was dissected at the bench surgery and the fluorescence allowed an easy identification of multiple lymph nodes for further study by regions. A Pinpoint (Novadaq/Stryker®) was used for all the steps of the procedure.
Results: ICG fluorescence presented the following advantages during the interventions: 1- Location of the lesion; 2- Lymph node mapping; 3- Location of lymph nodes uptake outside the D2 region; 4- Its diffusion through the lympho-fatty tissue allowed an easy identification of the different surgical planes, 5- Assessment of the perfusion in the anastomoses after intravenous administration; and finally, 6- facilitate the location of lymph nodes uptake in bench surgery for its referral to pathology study.
Specimen examination revealed a ypT4a ypN0 (GR3) and the second ypT4a ypN0
Both patients were discharged without postoperative complications.
Conclusion: The use of ICG fluorescence during a total gastrectomy with D2 lymphadenectomy facilitates surgery, lymph node location, ensures correct perfusion of the anastomoses and helps to identify lymph nodes in bench surgery.
Upper GI—gastric cancer
V251—Laparoscopic D2 subtotal gastrectomy with preservation of Hirtle artery for gastric outlet occluding cancer
Alessia Fassari, MM Lirici, A Biancucci, F Falbo, F Falaschi
San Giovanni Addolorata Hospital Complex, General Surgery, Italy
Aims: This video highlights the feasibility of laparoscopic intent-to-treat D2 lymphadenectomy even in difficult cases such as a subtotal gastrectomy for locally advanced pyloric cancer with complete obstruction of the gastric outlet. The laparoscopic approach was challenging both for gastric distension and for the presence of an aberrant left hepatic artery (ALHA) arising from the left gastric artery (LGA), but with proper technique may be accomplished with safety and efficacy.
Methods: A 80-year-old woman admitted for significant weight loss, vomiting and abdominal pain over the last three months. Pre-operative workup, including CT scan and endoscopy, showed T4 N + pyloric occluding cancer. Three-trocar laparoscopic d2 subtotal gastrectomy was attempted. Standard D2 lymphadenectomy, including nodes of station 4sb, 4d, 5, 6, 8a, 9, 11p and 12a dissection was performed. Then the left gastric vein was divided and LGA identified and skeletonized from its origin from the caeliac trunk. The ALHA was preserved accomplishing group 7 node dissection. D2 lymphadenectomy is then completed with the dissection of the lymph nodes along the lesser curvature (group 3) and the right cardiac nodes (group 1). Mechanical Roux-en-Y side-to-side gastrojejunostomy was accomplished for gastrointestinal reconstruction after emptying the residual stump from its contents.
Result: Postoperative course was uneventful, and the patient was discharged on postoperative day 9.
The pathological report showed a poorly cohesive signet-ring cell carcinoma, with 30 out of 39 harvested nodes, resulting positive for cancer infiltration: pT4b pN3b R0.
Conclusion: Despites large occluding tumor and extensive node metastasis, an oncologic sound laparoscopic D2 lymphadenectomy with complete lesser omentum and en-bloc dissection technique may be performed. Preservation of large ALHA is laparoscopically feasible and may avoid transient early postoperative left liver dysfunction.
Upper GI—gastric cancer
V252—Laparoscopic D2 total gastrectomy with transverse colon resection after neo-adjuvant chemoterapy for locally advanced gastric cancer
Andrea Biancucci, F. Falbo, A. Fassari, M.M. Lirici
San Giovanni—Addolorata Hospital Complex, Department of Oncological Surgery, Italy
Aim: An oncologic sound laparoscopic total gastrectomy with D2 lymphadenectomy for locally advanced gastric cancer is challenging but may be carried out even in complex cases li the one showed in this video.
Methods: A 55-year-old symptomatic woman with a huge mass infiltrating both the posterior gastric wall and the transverse colon and mesocolon and a gastroscopy negative for endoluminal lesions, was referred to surgery for diagnostic laparoscopy and following histologic assessment. Laparoscopy showed a malignant tumor presumably arising from the stomach and infiltrating the transverse colon with localized peritoneal and omental seeding. Histology confirmed the gastric origin of tumor and the patient underwent neo-adjuvant therapy. Re-staging after 6 months by CT scan revealed a significant decrease in gastric wall thickening, shrinkage of lymphadenopathy, and disappearance of disseminated peritoneal lesions. After multidisciplinary discussion, the patient was addressed to surgery with the aim of performing an intent-to-treat procedure. The patient underwent laparoscopic spleen-preserving total gastrectomy with D2 lymph node dissection en-bloc with transverse colectomy. No disseminated tumors were observed intraoperatively. Opposite to standard laparoscopic D2 lymphadenectomy, node dissection started with dissection of node 12a followed by group 8, 9, 7, 11p node dissection. Gastric and node dissection was furthered with excision of group 1 and 2 nodes, opening the hiatus according to Pinotti, dissecting free the distal esophagus with bilateral vagotomy, and then dissecting group 10 and 4 nodes. The entire upper and mid stomach was fully mobilized at this point. The mid third of transverse colon with relevant mesocolon appeared indissociable from the posterior gastric wall. An en-bloc segmental resection of the transverse colon was carried out after proximal and distal third colo-epiploic detachment. This step allowed the identification of the right gastroepiploic vessels which were ligated and divided thus completing the D2 lymphadenectomy. The gastrointestinal tract was reconstructed with a Roux-en-Y gastrojejunostomy and a side-to side colo-colic mechanical anastomosis.
Results: Total operative time was 400 min. Histo-pathology exam showed an intestinal and diffuse gastric signet ring cell carcinoma (GSRC), poorly differentiated and staged as pT1b (submucosal invasion) and pN0 (0 out of 67 nodes harvested/examined). All margins were negative (R0) with no evidence of perineural or lympho-vascular invasion. The patient had an uneventful recovery. She is still alive without any evidence of local recurrence or metastatic disease at 6-month follow-up.
Conclusions: Laparoscopic total gastrectomy with D2 lymphadenectomy for gastric cancer is technically feasible and is safe in the hands of experienced surgeons even in difficult and challenging advanced cases. Benefits of minimally invasive surgery, combined with the increasing evidence of oncologic results, similar to those of open surgery and its superiority in term of postoperative QoL are a key factor for the implementation of laparoscopy in the treatment of malignant gastric diseases.
Upper GI—gastric cancer
V253—Laparoscopic distal gastrectomy in ten steps
Jeancarlos J. Trujillo Díaz, Ruiz-Soriano, Jezieniecki-Fernández, Gómez-Sanz, Cabezudo-Molleda, Herreros-Rodríguez, González-Perea, Montes-Manrique, Beltrán De Heredia
Valladolid University Clinic Hospital, General And Digestive Surgery, Spain
Aims: We present a laparoscopic approach to treat the case of a patient with gastric adenocarcinoma (cT1bN0M0—Stage Ia), we performed a laparoscopic distal gastrectomy.
Methods: Video presentation.
Results: We present a laparoscopic distal gastrectomy in a patient with distal gastric adenocarcinoma; we try to summarize the surgery in ten main steps. 1st Step: Access to lesser sac via supracolic approach. 2nd Step: Gastro-epiploic vessels dissection. 3rd Step: Common and proper hepatic artery dissection, right gastric vessels dissection. 4th Step: Duodenal transection distal to the pylorus using a gastrointestinal anastomosis stapler (GIA) device. 5th Step: Celiac trunk and left gastric vessels dissection. 6th Step: Gastric transection using a GIA device, at least 5 cm from the tumour. 7th Step: Explorer the ligament of Treitz and, small bowel transection 30 cm from the Treitz. 8th Step: Roux in Y reconstruction is started, a vertical antecolic mechanical gastro-jejunal (GJ) anastomosis is performed on the posterior gastric wall, and the enterotomy is closed with a 3/0 barbed suture. 9th Step: Carry out the second anastomosis (jejune-jejunal JJ) 60 cm from the GJ anastomosis, mechanical side-to-side isoperistaltic anastomosis and the enterotomy was closed with a 3/0 barbed suture. 10th Step: Finally, a pfannenstiel mini-incision was performed to remove the specimen into an endobag.
Conclusion: The laparoscopic approach to treating distal gastric adenocarcinoma is a safe technique and we can summarize it in ten main steps.
Upper GI—gastric cancer
V254—Laparoscopic intragastric resection of a gastrointestinal stromal tumor
Pablo Marcos-Santos, M. Toledano-Trincado, C. Tinoco-Carrasco, F.J. Tejero-Pintor, E. Choolani-Bhojwani, F. Acebes-Garcia, A.D. Bueno-Cañones, S. Veleda-Belanche, J.I. Blanco-Álvarez, D. Pacheco-Sánchez
Hospital Universitario del Río Hortega, Servicio de Cirugía General y del aparato Digestivo, Spain
Aims: Laparoscopic intragastric surgery allows for safe and effective tumor resection that are too extensive for endoscopic resection. Herein in this work, we present a case of a laparoscopic intragastric resection of a gastrointestinal stromal tumor (GIST).
Methods: 63-year-old male patient with no past medical history, referred dyspepsia. A gastroscopy study showed a 2 cm gastric subcardial tumor. Fine needle puncture aspiration (PAAF) was performed by ecoendoscopy was informed as a GIST tumor. With these findings, surgical treatment was proposed with laparoscopic intragastric resection.
Results: Laparoscopic approach was initiated using one trocar of 12 mm and two of 5 mm. The first step of the surgery was dissection of the angle of Hiss and the lesser curvature of the stomach. Three additional trocars with ballons were placed in the interior of the stomach. GIST tumor was located at the stomach cardia, near the eshopagueal gastric junction. Complete excision of the tumor was completed with a full-layer suturing at the surgical site. Surgical specimen was extracted through one of the trocars incisions in the stomach Patient was discharged home on the third postoperative day. Pathology exam confirmed it as a low grade GIST with no risk and had free margins (pT1).
Conclusion(s): Gastric mucosal and submucosal lesions can be removed endoscopically, laparoscopically or with an open approach, depending on the size, location and growth type of the lesion. Laparoscopic intragastric resection for early gastric cancer and GIST is safe and feasible. The advantages of this procedure are excellent visualization, the ability to perform full-thickness resection and manage perforations. One of the disadvantages is the loss of “gastroperitoneum”, which we were able to manage by opening one of the trocars located in the peritoneal cavity. Location and trocar insertion through the abdominal wall is a key point. Trocars should be situated in accordance with the principles of general laparoscopy where, when compressed with a hand, the abdominal wall is in contact with the anterior gastric wall, and at least 3 cm apart To reduce the incidence of fistula formation full-layer suturing is required and has demonstrated faster healing of the mucosa.
Upper GI—gastric cancer
V255—High Laparoscopic linear stapled Oesophago-jejunal anastomosis: step by step demonstration of the set-up and tips including use of barbed suture
Pradeep Patil
Ninewells hospital and medical school, UpperGI surgery, United Kingdom
This video demonstrates the series of steps involved in setting up and performing a safe oesophago-jejunal anastomosis using a linear stapler after a radical D2 total gastrectomy.
1.Oesophagus can be divided up to 5 cm from the gastro-oesophageal junction safely. This needs adequate mobilisation of the mediastinal oesophagus so that the oesophagus can be brought down to the hiatus to enable suturing at this level. This can be achieved laparoscopically without widening or dissecting open the hiatus and utmost care taken not to breach the pleura on either side which has implications during postoperative recovery.
2.Fix the anterior wall of the oesophagus 1 cm from the stapled end to the crus with a full thickness suture. This is crucial as it prevents oesophageal retraction and also extremely helpful when performing the posterior esophagotomy for the stapling.
3.Two stay sutures are placed at the edges of the oesophageal stapled end. These sutures are extremely helpful in exposing the edges of the staple line during closure of the anastomosis. These ends along with the oesophageal staple line will be incorporated in the second layer during suture closure of the oesophagojejunostomy site.
4. The length of the alimentary limb of the jejunum should be at least 50-60 cm. This is important for preventing bile reflux in the long term but will be crucial in the short term if the adverse event of an oesophago-jejunal anastomotic leak as presence of bile delays healing significantly.
4.Suture fixation of the jejunum to the posterior oesophagus. This enables creation of controlled oesophagotomy and jejunostomy directly beneath and the safe introduction of the stapler.
5.The oesophagotomy is created on the posterior wall of the oesophagus 1 cm proximal to the staple line. The previously placed anterior fixation suture holds the lumen open and makes this step safer and easier.
6.The jejunostomy should be made directly underneath the oesophagotomy. The further away it is made, the larger the opening which directly correlates with difficulty in closure and increases the risk of failure of the anastomosis.
7.The stapler is fired ensuring the two edges of the openings in the oesophagus and jejunum are close keeping the opening as small as possible.
8.The nasogastric tube is passed just beyond the anastomosis.
9.Closure in 2 layers with barbed suture. Staple line to staple line closure. The first layer includes the posterior wall of the oesophagus. The second layer incorporates the staple line along with the anterior wall of the oesophagus securing the anastomosis.
10.The anastomosis is checked for air leak and by methylene blue dye test and the nasogastric tube is removed.
Patient is allowed oral fluids on the evening of the operation.
This particular patient was discharged home on a soft diet on postoperative day 6 and remains well with no recurrence at 18 months.
Upper GI—gastroduodenal diseases
V031—Single-port intragastric wedge resection using the “tunnel” method
So Kang, S.J. Lee, Y.S. Park, S.H. Ahn, Y.S. Suh, H.H. Kim
Seoul National University Bundang Hospital, Surgery, Korea
Gastric wedge resection is performed to treat gastric submucosal tumors (SMTs), and intragastric wedge resection is especially useful for SMTs that are mostly endophytic. However, the procedure is a difficult to perform for some patients whose stomach is far from the umbilicus, where the stomach is often pulled out to create the intragastric opening. The tunnel method using another wound retractor was developed to overcome this hurdle. This video shows how single-port intragastric wedge resection using the tunnel method is performed for a female 38-year old patient presenting with a gastric SMT in the cardia.
Upper GI—gastroduodenal diseases
V032—Laparoscopic gastric resection for recurrent ulcerative bleeding after X-ray endovascular embolization of the left gastric artery
Alexander Voynovskiy, D. Kulikov, M. Tokarev, D. Mudryak, E. Belykh
Sechenov University, Abdominal, Russia
Purpose: to show the features and different treatment methods of patients with bleeding ulcers.
Research methods: a 62-year-old man with stomach ulcer for 10 years. Has admitted with complaints of hematemesis, melena general weakness. The ulcer of the lesser curvature of the stomach with Forrest II B bleeding was diagnosed by gastroscopy. Combined endoscopic hemostasis was performed. At revision after 2 h, bleeding from the ulcer persists—Forrest 1 B, X-ray endovascular occlusion of the left gastric artery was performed. The bleeding was stopped, but after 3 days the condition worsened with the bleeding recurrence clinic. An emergency EGDS was performed—the stomach ulcer, like a source of recurrent Forrest IB bleeding was revealed. Taking into account the recurrent bleeding, laparoscopic resection of 2/3 of the stomach with the Roux-en-Y gastrojejunostomy was performed.
Results: the early postoperative period was favorable. With fluoroscopy after surgery, the gastroenteroanastomosis is passable, there were no streaks. The patient was discharged on the 7th day after surgery.
Conclusions: endoscopic hemostasis and X-ray endovascular occlusion is a minimally invasive and less traumatic method. It can be used to treat bleeding ulcers of the stomach and duodenum. If these methods are ineffective and the bleeding recurs, it is necessary to perform a laparoscopic gastrectomy.
Upper GI—gastroduodenal diseases
V037—Laparoscopic management of an Intragastric Fork
Aurelio Francisco Aranzana Gómez, Juan Sebastian Malo Corral.
Complejo Hospitalario Universitario De Toledo, General And Digestive Surgery, Spain
Introduction: Of the foreign bodies that reach the stomach, 80 to 90% pass spontaneously through the GI tract, 10-20% require nonoperative intervention, and ≤ 1% require surgery. Thus, conservative management is appropriate for most blunt objects in asymptomatic patients. However, objects > 6 cm in length or objects > 2.5 cm in diameter rarely pass through the stomach.The aim of the video is to demonstrate the safety and efficacy of the laparoscopic approach for the definitive treatment in cases with gastric foreign bodies.
Methods and procedures: Clinical case: A 32-year-old woman attends the emergency room after accidental foreign body ingestion. Physical examination reveals abdominal pain to palpation in the epigastrium without defense. Abdominal x-rays with chest x-rays shows a fork in the epigastrium region. The complementary explorations and iconography of interest are exposed. Given the evolution, an endoscopy was performed which allows detailed identification of the gastric foreign body but it was not possible to extract the foreign body so a surgical management is proposed.
Result Laparoscopic approach is performed, with 4 trocars. The video shows a fork inside the body of the stomach, bigger than 15 cm. Vertical anterior gastrotomy, extraction of the foreign body with endo-loop fixation. Washing, continuous suture of the gastrotomy in transverse with vicryl 2/0, epipoplasty with Vicryl 3/0. Extraction of the foreign body from the abdominal cavity. Correct postoperative course and discharge on the 3th. PO day.
Conclusions: Usually foreign bodies that pass through the esophagus are asymptomatic unless perforation or obstruction occurs. Imaging studies may identify the foreign object and are useful for following the progression through the GI tract. Foreign bodies management depends on several factors: location of the object, nature of the object and symptoms and signs. Management depends on the nature of the object, but sharp objects should be retrieved from the GI tract. The laparoscopic approach is a valid alternative in the treatment of big foreign bodies and the size does not contraindicate this type of approach in advanced laparoscopic skilled surgeon.
1. ASGE Standards of Practice Committee, Ikenberry SO, Jue TL, Anderson MA, et al.: Management of ingested foreign bodies and food impactions. Gastrointest Endosc 73:1085–1091, 2011. https://doi.org/10.1016/j.gie.2010.11.010.
Upper GI—gastroduodenal diseases
V038—Laparoscopic treatment of megaduodenum lithiasis in chronic intestinal pseudo-obstruction
Davide Moioli, L. Baldari, E. Cassinotti, F. Cantore, M. Chiappetta, L. Boni
Fondazione IRCCS Ca' Granda Ospedale Maggiore Policlinico Milano, General Surgery, Italy
Aim: Chronic intestinal pseudo-obstruction (CIPO) is a syndrome characterized by derangement of gut propulsive motility which resembles mechanical obstruction, in the absence of obstructive process.Based on histological features CIPO can be classified into three main categories: neuropathies, mesenchymopathies, and myopathies, according on the predominant involvement of enteric neurones, interstitial cells of Cajal or smooth muscle cells.This video shows a case of important lithiasis in 38 years old woman with megaduodenum secondary to myopathic CIPO treated by laparoscopic duodenotomy, gall-stone extraction and duodenum-jejunal anastomosis and final cholecystectomy.
Methods: A 38 years old female patient(suffering of CIPO with mega-stomach and mega-duodenum diagnosed in 2018 and previously underwent to total gastrectomy for multiple episodes of emesis and intestinal obstruction),was submitted to a gastroenterologic evaluation for nausea,periodical emesis and right upper quadrant pain conditioning low quality of life.She underwent to abdominal MRI showing several polyhedral findings compatible with stones in residual megaduodenum (diametres 8 cm × 6,3 cm × 12,5 cm).As further investigation a double-baloon enteroscopy was performed showing the same findings. After multidisciplinary discussion, according to patient, explorative laparoscopy was performed.Patient supine positioning,optical trocar was right para-umbilical inserted.Exploration of abdominal cavity shows megaduodenum with abnormal motility.12 mm trocar was inserted in left hypocondrium, 5 mm trocars were inserted in left iliac fossa and sub xifoidal.Kocker’s maneuver and smooth colon detachment from duodenum was performed with energy help.After duodenum mobilization, duodenotomy is done showing lithiasis into duodenum lumen.Extraction with grasper of all gall-stones which were posed in endobag.Identification of jejunal loop, mechanical side to side anastomosis was performed.Washing of abdominal cavity,laparoscopic cholecystectomy and specimen extraction.
Results: Postoperative course was characterised from bar pain (laboratory tests were negative for pancreatitis) and paralytic ileus.After Gastrografin administration plentyful passage of stool.Parenteral nutrition was administrated at first.After 5 days oral intake was started.Patient was discharged on postoperative day 12.
Conclusion: Treatment of intestinal pseudo-obstruction involves nutritional, pharmacological and surgical therapies.In this case, duodenum lithiasis, linked to CIPO motility derangement and residual megaduodenum,was faced with laparoscopic treatment in order to avoid open approach with all surgical complication linked to, and improve patient’s quality of life.
Upper GI—gastroduodenal diseases
V039—Laparoscopic treatment of gastrointestinal stromal tumor with duodenal location
Giulia Vitiello, J.H. Ye Zhou, S. Gonzalez Abos, S. Fernandez-Ananin, C. Balague Ponz
Hospital de la Santa Creu i Sant Pau, General surgery, Spain
Introduction: Gastrointestinal stromal tumors (GISTs) are the most common mesenchymal tumors located in the alimentary tract. The most frequent locations are the stomach (56%), small bowel (32%), colorectum (6%) and esophagus (< 1%). Surgery is the only potentially curative treatment for suspected resectable GIST. The objective is to ensure clear resection margins and extirpate the tumor without pseudocapsule rupture. Minimally invasive surgery was shown to reduce length of the hospital stay, blood loss, and morbidity with same R0 and tumor rupture rates, overall in the common location like the stomach. The main limitation to laparoscopy resection is technical difficulty due to tumor size and location.
Methods: We present a case of GIST located in the duodenum. It’s the case of 80-years-old woman with severe anemia (Hb 58). Gastroscopy showed a submucosal lesion, 3 cm in diameter, in the back side of duodenal bulb. Eco-endoscopy detected a hypoechogenic and heterogenic lesion with hipervascularization. Biopsy revealed only inflammatory infiltrates, without neoplasia evidence. TC showed solid, hipervascular, endoluminal lesion in first/second duodenal portion, suggesting of GIST. We decided to perform a laparoscopic exploration to evaluate the possibility of resection with minimal invasive approach.
Results: Four ports were used, 1 of 12 mm and 3 of 5 mm. We observed the lesion in the front side of first duodenal portion, so we started the surgery with the dissection of adhesions around it. Then we marked the borders of lesion and proceeded to the resection with adequate margins. The remaining gap was closed with continue suture. We dismissed leaks with administration of the methylene blue through nasogastric tube. We realized a protector patch with omentum. An aspirative drainage was left in place. The specimen was removed from the umbilical incision of 12 mm. The surgery was performed in 60 min. The patient was discharged at the 4 postoperative day and there were no postoperative complications.
Conclusions: GIST surgery does not require wide margins of resection to improve the disease control. Therefore a minimally invasive approach is the best option in less frequent locations as well, because it reduces the length of the hospital stay and the morbidity.

Upper GI—gastroduodenal diseases
V040—Laparoscopic treatment of the celiac artery compression due to median arcuate ligament
Gabriela Rojas de la Serna, A. Morandeira Rivas, C. Moreno Sanz, M.L. Herrero Bogajo, J. Riquelme Gaona, M. López Saiz, J. Cortes Vela1, G. Tadeo Ruiz
General hospital La Mancha Centro, General gastrointestinal surgery, 1Radiology, Spain
Introduction: Median arcuate ligament syndrome, also known as celiac trunk compression syndrome or Dunbar syndrome, is a rare disease with an incidence lower than 2 cases per 100.000 inhabitants/year. It is a rare cause of chronic intestinal chronic ischemia, being its main clinical manifestations: postprandial abdominal pain (80%), weight loss (48%), nausea (10%) and diarrhoea (8%). Low insertion of the arcuate ligament or a high origin of the celiac trunk is usually the cause of the celiac trunk compression. Diagnosis is generally reached by the exclusion of other diseases, due to non-specificity of the symptoms. Computed tomography angiography is the most frequently imaging technique used.
Surgery is indicated in symptomatic patients, with endovascular treatment as a second-stage procedure for refractory cases.
Material and methods: In this video we present the case of an 80-year-old male with a history of high blood pressure, mild aortic valve regurgitation and essential tremor, who attended surgery consultation derived from the Internal Medicine department due to chronic postprandial abdominal pain of several months of evolution, accompanied by weight loss and requiring several hospital admissions. After several investigations, the patient was diagnosed with celiac artery stenosis due to the median arcuate ligament. The computed tomography angiography revealed a 5 mm stenotic segment at the end of the celiac trunk with a calibre of 0.9 mm and a post-stenotic dilation with a calibre of 9.7 mm, which determined stenosis of 90%. In the selective arteriography these results were confirmed.
Results: The patient was scheduled for minimally invasive surgery. The procedure was initiated by accessing the lesser sac, dissecting with the harmonic scalpel the origin of the left gastric, splenic and hepatic arteries. The fibres of the diaphragmatic crura were then dissected, exposing the aorta. Subsequently, the fibres around the celiac trunk were dilacerated until its complete origin in the aorta was released. Six months after the intervention, the patient is asymptomatic, computed tomography angiography objectifying a complete release of the celiac trunk compression.
Conclusions: Arcuate ligament syndrome is a diagnostic challenge, being sometimes difficult to discern if it is the cause of the symptoms or a mere radiological finding. Minimally invasive surgery is a safe and effective option for the liberation of the celiac trunk.
Upper GI—gastroduodenal diseases
V041—Laparoscopic resection of duodenal gastrointestinal tumour
Cristina Bertani, E. Cassinotti, L. Baldari, M.F. Chiappetta, J. Guraj, M. Della Porta, L. Boni
University of Milan— Fondazione IRRCS Ca Granda, Ospedale Maggiore Policlinico., General Surgery, Italy
Aim: This video shows our technique to perform laparoscopic resection of duodenal gastrointestinal stromal tumour (GIST)
Methods: The patient is a 28 years-old man suffering from growing weakness and melena. Esofogastroduodenoscopy (EGDS), performed at admission in the Emergency department, revealed 2,5 cm bleeding ulcerative lesion in the 3rd portion of duodenum, initially treated with endoscopic hemostatic clips and argon plasma coagulation (APC). The histopatological examination on biopsies confirmed the diagnosis of GIST. Both staging CT and PET scan confirmed the presence and site of the lesion, in absence of distant metastasis. Patient was scheduled for a laparoscopic exploration and resection. The patient was placed supine with legs opened. 5 trocars were placed: two 10 mm ports in umbilicus and left flank, three 5 mm ports under right subcostal line and in right hypochondrium. The lesion was confirmed both at laparoscopic exploration of the abdominal cavity (presence of endoscopic tattoo at the posterior wall of the 3rd portion of duodenum) and with intraoperative EGDS. A cautious dissection of the distal portion of duodenum was performed especially from posterior planes through smooth manouvers and using advanced energy device; with endoscopic assistance, visceral section was conducted with mechanical stapler, after an intraoperative real-time assessment of bowel perfusion using indocyanine green (ICG) fluorescence technology. Intracorporeal side-to-side duodenal-jejunal stapled anastomosis was performed. The specimen was extracted through an endobag through one of the trocar access.
Results: Post-operative course was uneventful and the patient was discharged on postoperative day 10. Histopathological examination confirmed the diagnosis of GIST, confined to the muscular layer with free resection margins, kit + : V prognostic group. So the patient was finally treated with adjuvant therapy.
Conclusion: Lesions of distal part of duodenum might be challenging and technically demanding. Full laparoscopic approach can be used in high-expertise surgical centres. Intraoperative EGDS assistance might be of help in precisely locate the lesion. ICG fluorescent real-time angiography to assess bowel perfusion is a valuable tool to perform a safer anastomosis.
Upper GI—gastroduodenal diseases
V042—Laparoscopic excision of para-aortic lymphangioma
Davide Moioli, L. Baldari, E. Cassinotti, C. Bertani, M. Della Porta, L. Boni
Fondazione IRCCS Ca' Granda Ospedale Maggiore Policlinico Milano, Chirurgia generale, Italy
Aim: Lymphangioma is a rare benign congenital tumor characterized by an abnormal accumulation of lymphatic fluid. It is thought to occur as a result of the proliferation and dilatation of the lymphatic sacs due to developmental defects of lymphatic vessels.This video shows a case of incidental diagnosis of para-aortic lymphangioma in a 40 years old woman treated by explorative laparoscopy and lesion’s excision.
Methods: 40 years old female patient suffering from left lumbar pain was treated at home with painkillers without benefit.She underwent abdominal ultrasound and CT scan showing close to pancreas tail an oval hypodense lesion (6,5 cm × 8,5 cm) with 4 mm wall thickness with slight mass-effect on left kidney and a 4 cm lesion at segment 7 of the liver.As further investigation MRI was performed confirming the presence of cystic lesion close to aorta, anteriorly left kidney and inferiorly to pancreas tail, localized in mesentery.First radiologic hypothesis was echinococcus cyst.Microbiological tests for Echinococcus was performed with negative results. Percutaneous needle biopsy of liver lesion was performed with no tumoral cells identification. After multidisciplinary discussion, according to patient, explorative laparoscopy with eventual distal spleno-pancreasectomy was planned.After patient positioning on right flank, an optical trocar was supra umbilical inserted. Exploration of left para-aortic region showed the known 8 cm diameter capsulated lesion covered by descendent mesocolon;After 5 mm trocars positioning right subcostal and left ipohypochondrium, the excision was performed with smooth maneuvers and advanced energy device support. During circumferential mobilization two venous vessels (probably lumbar branches directed into the lesion) have been identified, clipped and cut.After smooth dissection from Treitz ligament, the lesion was carefully and completely detached along the upper pole from pancreatic tail.Specimen was placed in an endobag and removed.
Results: Postoperative course was uneventful and the patient was discharged on postoperative day 7. Histopathological examination reported benign cystic lymphangioma.
Conclusion: Mesenteric cystic lymphangioma is rare tumor, often with incidental diagnosis.The recommended method of treatment is total excision due to low recurrence rate (12-17%).Laparoscopic excision of para-aortic lymphangioma is feasible, requiring adequate pre-operative imaging and laparoscopic expertise.
Upper GI—gastroduodenal diseases
V256—Post-Nissen gist: laparoscopic resection
Aurelio Francisco Aranzana Gómez, Juan Sebastian Malo Corral, Aída Tébar Zamora
Complejo Hospitalario Universitario De Toledo, General And Digestive Surgery, Spain
Introduction: Objectives: Laparoscopic partial gastrectomy with adequate margins is the technique of choice for GIST-type gastric tumors. However, resection can be complex in patients previously operated of the hiatus with the performance of NISSEN, due to the proximity to the fundoplication and difficulty of localization. Furthermore, in small tumors, given the submucosal growth, it can be difficult to fully identify the lesion and secure the resection margins. The objective of this study is to show the safety and efficacy of the laparoscopic approach to guarantee both oncological resection and correct gastric emptying in the treatment of a 'post-Nissen GIST'.
Material and methods: Clinical case: A 47-year-old female patient with a history of laparoscopic Nissen 10 years ago due to hiatal hernia and pathological reflux, under follow-up for this reason. A submucosal tumor was detected in the gastric body in endoscopic control, endoscopic ultrasound was performed: submucosal tumor of the gastric body below the fundoplication in the theoretical anterior situation, 27 × 66 mm, with AP: GIST (CD117 + , DOG1 + , CD34 + , AML + , Desmin-, S-100 -, Ki-67 1%). The study was completed with EGD and CT: no signs of metastatic disease were evident.Results: Intervention: complete laparoscopic approach, 5 trocars, release of adhesions from previous surgery, identification of the Nissen, normopositioned, the lesion is not visualized on the anterior face, opening of the gastrocolic ligament, identifying a lesion with serous involvement of 4 cm, below the Nissen, marking with traction points with margins, tutoring with a FOUCHÉ probe, number 36, endoscopic control is not necessary to ensure resection with margins and absence of stenosis with successive loads of EndoGIAtion, keeping constant tutoring.Correct postoperative, discharge on the second day. Definitive pathological anatomy: low grade GIST tumor, ckit + , free margins. Asymptomatic with rx. normal control 12 months after surgery.
Conclusions: The laparoscopic approach is a valid and safe alternative in gastric GISTs, even in those with a posterior location of moderate size after previous gastric surgery such as a Nissen.
Upper GI—gastroduodenal diseases
V257—Laparoscopic feeding Jejunostomy made easier with use of barbed suture
Pradeep Patil
Ninewells hospital and medical school, UpperGI surgery, United Kingdom
This video demonstrates the steps of laparoscopic formation of a feeding jejunostomy.
The steps outlined are similar to steps carried out during open surgery:
Identification of suitable segment of jejunum 20-30 cm distal to the DJ flexure or distal to jejuno-jejunal anastomosis
Fixation of identified segment of jejunum to left lateral abdominal wall
Purse-string suture 2-3 cm from fixation point with enterotomy at centre
22 Fr Jejunostomy tube inserted & balloon inflated
3-point fixation replaced by use of barbed suture fixation.
Final fixation suture 1-2 cm distal to jejunostomy site.
The use of barbe suture to fix the jejunostomy site to the abdominal wall eliminates the need for the three separate sutures needed for the three-point fixation. The complex manoeuvres required for the safe completion of these three sutures was a significant detraction for most laparoscopic surgeons. We hope that this technique demonstrating the use of barbed suture will help more surgeons complete this task laparoscopically benefitting more patients.
Upper GI—gastroduodenal diseases
V258—Intratoracic acute mesenteric-axial gastric volvulus: laparoscopic management
Jeancarlos J. Trujillo Díaz, M. Ruiz-Roriano, C. Jezieniecki-Fernández, T. Gómez-Sanz, G. Cabezudo-Molleda, J. Herreros-Rodríguez, Núñez Del Barrio, Montes-Manrique, Beltrán De Heredia
Valladolid University Clinic Hospital, General And Digestive Surgery, Spain
Aims: Intrathoracic gastric volvulus has a low incidence; it is usually associated with a hiatal hernia. There are three types: organ-axial, mesenteric-axial, and a combination of both. In the mesenteric-axial the body and the gastric antrum are rotated along the short axis of the stomach that leads to the anterior gastric wall folding on itself. We present a video of a patient diagnosed with acute mesenteric-axial gastric volvulus.
Methods: Video presentation.
Results: 62-year-old woman came to the emergency room due to nausea and vomiting during 4-5 days, associated with abdominal pain and abdominal distention. Physical examination: the abdomen was distended, dull on percussion, depressible and generally painful on palpation without signs of peritoneal irritation. Blood analysis: Hemoglobin: 11.2 g/dL Leukocytes: 21630 Neutrophils: 90% C-reactive protein: 33U/L. Abdominal computed tomography (CT) scan was performed in which significant gastric distention associated with torsion of the gastric chamber was observed with introduction of the antro-pyloric through the esophageal hiatus towards the supra-diaphragmatic region, which is compatible with mesenteric-axial gastric volvulus. With the diagnosis of intrathoracic mesenteric-axial gastric volvulus associated with hiatal hernia, we decided to perform urgent surgical intervention using a laparoscopic approach.
Intraoperatively, a large gastric distention and large hiatal hernia with intrathoracic gastric volvulus (antro-pyloric region inside the hernial sac) is visualized, the gastric wall is visualized with signs of intestinal distress that improve after reducing the hernial content. Laparoscopic approach is performed using 5 trocars, reduction of the herniated gastric content and later dissection and complete resection of the hernial sac, dissection of both pillars and raffia of the same with non-absorbable suture, later it is verified that the gastric wall presents better appearance without being evident ischemic signs and a Nissen-type fundoplication (Floppy Nissen) was performed.
The patient presented a satisfactory evolution, with improvement in abdominal pain, good oral tolerance and good intestinal transit, clinical and analytical improvement of the inflammatory parameters, for which she was discharged on the fourth postoperative day.
Conclusions: Treatment in urgent pathology is always surgical; in non-urgent pathology, the "gold standard" approach is the laparoscopic one with a low morbidity and mortality rates, however, in urgent pathology the laparoscopic approach depends on the experience of the surgeon, as in the case presented that a laparo scopic surgical treatment could be performed with a favorable patient evolution.

Upper GI—Reflux-Achalasia
V110—Laparoscopic treatment of recurrent hiatal hernia after hiatal hernia repair with mesh and Collis gastroplasty with Nissen fundoplication
Eduard Galliamov1, M.A. Agapov2, V.V. Kakotkin3, D.R. Markaryan2, V.A. Kubyshkin2
1Sechenov University, General Surgery, 2Medical Research and Educational Center (Lomonosov University Clinic), General Surgery and Oncology, 3Moscow State University, Faculty of Medicine, General Surgery and Oncology, Russia
Gastroesophageal reflux disease (GERD) is a condition that reduces the quality of life and can cause disorders associated with acid reflux, such as bronchial asthma, Barrett's esophagus and esophageal adenocarcinoma. GERD can lead also to esophagitis with reflux-induced strictures and dysphagia.
Laparoscopic antireflux surgery are becoming more frequent tool in the treatment of GERD. In this case, according to the literature, symptoms od dysphagia in the postoperative period arise again in 3-30% of patients, which leads to the fact that 3-6% of them are operated repeatedly.
Patient was a 79-year-old woman, a diagnosis of GERD was confirmed 10 years ago. In 2015, the Laparoscopic hiatal hernia repair with mesh and Collis gastroplasty with Nissen fundoplication was performed. 1 month after the surgery, the patient complained of upper abdominal pain, heartburn, and dysphagia. Recurrent hiatal hernia has been diagnosed in 2017.
In August 2020 the patient was performed laparoscopic treatment of recurrent hiatal hernia. During surgery in the area of the esophageal hiatus a mesh implant, circularly fixed with protack fixation device, was visualized. In addition, a recurrent axial hernia of 6 × 5x4 cm was found. The gastric cuff after fundoplication by Nissen was consistent.
Laparoscopic repair of recurrent hiatal hernia with the removal of the mesh implant and titanium tack was performed. Cruroraphy was performed for the repair of the hiatal orifice. The patient was discharged from the Department 4 days after the surgery. 4 months after the operation, the patient does not notice heartburn or pain in the upper abdomen, there is no dysphagia. According to x-ray data, no hernia recurrence was detected.
Conclusion: during repeated surgery, it is necessary to separate the previously performed antireflux reconstruction, isolate both crura of the the diaphragm, and excise the hernial sac. In addition, it is necessary to know all the features of the course of the postoperative period in this category of patients, as well as the presence of a gastroenterologist in the team.
Upper GI—Reflux-Achalasia
V111—What is the approach of choice in a perforation for Boerhaave Syndrome
Aurelio Francisco Aranzana Gómez, Aída Tébar Zamora.
Complejo Hospitalario Universitario De Toledo, General And Digestive Surgery, Spain
Introduction: Boerhaave syndrome is esophageal perforation as a consequence of violent vomiting. It was described for the first time in 1724 by Herman Boerhaave. It has a high mortality rate (35%). It is considered the most lethal of all perforations of the Digestive tract Symptoms are vomiting, chest pain, and cervical subcutaneous emphysema The perforation is almost always located on the left side of the lower esophageal third 2 to 3 cm from the esophagus-gastric junction. However, this triad is seldom present in its entirety, and abdominal pain is often the only symptom. Many types of treatment have been proposed for this disease, from nonsurgical management (Cameron criteria) to esophagectomy. The appearance of minimally invasive surgery and other endoscopic techniques has increased the possible therapeutic spectrum.
Objective: To demonstrate the safety and efficacy of the minimally invasive approach in patients with complex esophageal pathology. We present a patient who could benefit from laparoscopic surgery to overcome this serious disease.Material and method: Clinical case: 58-year-old male patient, AP: Smoker and alcoholism until March 2020. Paraseptal emphysema with bullae in LLSS, Hiatal hernia.; After having eaten normally presents, abdominal discomfort and vomiting with subsequent chest pain. He went to the emergency room where the symptoms were interpreted as acute coronary syndrome, being treated with a loading dose with double antiaggregation. After CT scanning, findings suggestive of esophageal perforation in the distal third, pneumomediastinum and left hydropneumothorax, compatible with Boerhaave syndrome: Due to the antiplatelet doses administered, it is decided to intervene come as a deferred urgency. He is transferred to the operating room 7 h after admission, with placement of a left TED and antibiotic coverage. The complementary tests of interest are exposed.
Results: Intervention: Complete laparoscopic approach, 5 trocars: hiatal hernia due to sliding, NO peritoneal contamination, perforation of Lower esophagus in left posterolateral aspect with longitudinal mucosal tear of 3 cm, opening of the diaphragm via Pinotti, dissection of the hiatus and mediastinal circumferential extended to the pulmonary vein, no tumor or stenosis is identified, severe fibrino-purulent mediastinitis with food debris, myotomy proximal and distal to the perforation, including oblique fibers distal to the IBD, exposing the entire mucosal perforation, continuous suture with barbed 2.0, myiorrhaphy in the background with pts. 3.0 vicryl loose leaflets, complete opening of the left pleura, partial decortication, abundant lavage. Check with methylene blue for the absence of leaks, anterior fundoplication type DOR- THAL fundic patch and anterior hiatorrhaphy, jejunostomy and mediastinal drainage. Postoperative with Pleural effusion with cultures: Rothia Mucilaginosa and Paenibacillus spp., which requires several radiological drains for resolution with Rx control. no leak with a good step.
Conclusion: The severity of Boerhaave syndrome depends on the time from its occurrence to its diagnosis. Therapeutic options include medical, endoscopic, and surgical management. Your knowledge for proper management since it is a disease with a very low incidence but high mortality. Laparoscopic surgery could be used efficiently and effectively for this patient, who undoubtedly benefited from the use of this minimal invasion: Treatment is mainly aimed at preventing mediastinitis, with surgical repair being the definitive treatment.
Upper GI—Reflux-Achalasia
V112—Laparoscopic excision of an epiphrenic diverticulum secondary to achalasia with Heller’s cardiomyotomy and anterior fundoplication
Helen Skinner, T. Lo, S. Dexter
Leeds Teaching Hospitals Trust, Department of Upper Gastrointestinal Surgery, United Kingdom
B Epiphrenic diverticula are outpouchings of the lower third of the oesophageal mucosa or sub-mucosa, thought to be associated with underlying motility disorders. Symptoms include dysphagia, regurgitation and aspiration and may be treated surgically. Traditionally a left thoracic approach was utilised however in recent years there has been a move towards minimally invasive technologies. Despite this there remains a high-risk of post-operative complications such as staple-line leak. We present the case of a 60-year-old male who underwent an excision of an epiphrenic diverticulum, a Heller’s cardiomyotomy and a Dor fundoplication for his achalasia.
Methods: Using a laparoscopic approach, the hiatus was mobilising using a standard technique. The diverticulum was carefully dissected away from the surrounding structures whilst preserving the Vagus nerve. After the diverticulum was free, a Heller’s cardiomyotomy was performed. The diverticulum was excised using two firings of an ‘Endo GIA 60’ laparoscopic stapler. The staple-line was buried using Ethibond sutures. Intra-operative endoscopy was used to assess the integrity of the staple-line and myotomy from the oesophageal lumen. After performing the cardiomyotomy and reconstructing the angle of His, an anterior fundoplication was performed.
Results: The resected diverticulum (65mmx35mmx2mm) showed stratified squamous mucosa with evidence of fibrosis and haemorrhage, consistent with a chronic diverticulum. The water-soluble contrast swallow performed post-operatively showed no evidence of staple line leak and free passage of contrast through the lower oesophagus. The patient recovered well post-procedure and was discharged. He returned two weeks later with epigastric pain and vomiting, however computerised tomography (CT) imaging with oral contrast showed only a small left sided pleural effusion, and endoscopy showed no oesophageal abnormalities. The patient’s symptoms resolved with conservative management and he was later discharged. He was reviewed in clinic two months post-operatively where he reported that his symptoms had not recurred.
Conclusions: There is no current consensus on the best surgical approach in the management of epiphrenic diverticula. Laparoscopic excision of an epiphrenic diverticulum with Heller’s cardiomyotomy and anterior fundoplication is demonstrated as a safe and effective technique.
Upper GI—Reflux-Achalasia
V113—Collis gastroplasty for recurrent hiatal hernia
Mario Morino, F. Rebecchi, A. Arezzo, N. Leone
University of Turin, General Surgery, Italy
Background: Redo surgery in patients with recurrent hiatal hernia is a technically demanding intervention, even more in laparoscopy. We report the case of a woman with a recurrent hiatal hernia after two surgeries: laparoscopic Toupet fundoplication and redo laparoscopic treatment with partial gastric fundus resection for recurrent hiatal hernia.
Clinical case: We present a case of a 55-year-old female patient with previous history of hiatal hernia with partial reflux and disphagia. In November 2019 she underwent surgery of laparoscopic partial 270 degree posterior fundoplication according to Toupet's technique and hiatal herniorrhaphy with non-absorbable stitches. Postoperative course was uneventful. After eight months we referred the patient a redo laparoscopic treatment of bring back to its intraabdominal position of the herniated stomach and partial gastric fundus resection for recurrent hiatal hernia. Postoperative course was uneventful. New access at the Emergency Department in November 2020 for dysphagia, reflux and vomit. Gastrographin esophagogram showed an intrathoracic hiatal hernia with slow gastrographin empting. After one week a new laparoscopic surgery was performed: gastric reduction into the abdominal cavity was then achieved by traction and dissection; the hiatal herniorrhaphy was well packaged. Due to the suboptimal state of the gastric fundus, a partial resection was performed to Collis technique. Finally, to prevent new gastric displacement, gastropexy to the anterior abdominal wall is performed with non-absorbable stitches. Postoperative course was uneventful and the patient was discharged on the fourth postoperative day.
Conclusion: Redo surgery in recurrent hiatal hernias is a demanding surgical treatment, even more in laparoscopy. We believe that the patients with this pathology can benefit from laparoscopic treatment, therefore we think this type of surgery should be done in referral centers with high laparoscopic experience.
Upper GI—Reflux-Achalasia
V114—Toupet technique laparoscopic approach to a previous failed nissen-rosetti
Bakarne Ugarte-Sierra, Irune Vicente Rodríguez,, R.A. Abad Alonso,, N. Ortega Machón, R. Maniega Alba, F.J. Ibanez Aguirre
Hospital Universitario de Galdakao, General Surgery, Spain
Aim: Show Toupet technique laparoscopic approach to a previous failed nissen-rosetti
Methods: description in video presentation
Results: We show the case of a man to whom a Toupet technique with a bioA mesh was performed due to the failure of a previous nissen-rosetti technique.
Conclusions: Toupet procedure is a technique to be considered in antireflux surgery
Upper GI—Reflux-Achalasia
V115—Laparoscopic transgrastric stapled esofagofundostomy for end-stage achalasia with sigmoid shaped esophagus
Carolina Naranjo-Checa, Eugenio Licardie, E .Licardie1, I. Alarcón-Del Agua, M. Socas, F. Francisco, S. Morales-Conde
University Hospital Virgen del Rocio, Unit of Innovation in Minimally Invasive Surgery, Department of General and Digestive Surgery, 1Quironsalud Sagrado Corazón, Seville, Unit of General and Digestive Surgery, Spain
Introduction: The Zaaijer modification of Heller’s cardiomyotomy is the standard of care for achalasia, which achieves satisfactory results in more than 85% of patients. However, up to 5% will show an ‘end stage’ achalasia where this surgical technique has poor outcomes since these patients have functionless highly dilated esophagus, not providing a relief of the dysphagia. Additionally, treatment options for recurrence of dysphagia after a primary Heller´s miotomy are limited and historically include a redo cardiomyotomy, balloon dilatation and esophagectomy. In these two circumstances, we can add to our treatment armamentarium other techniques, such as an esophago-gastrostomy, already described by Heyrovsky in 1913, a procedure that has suffered some modifications over the past few years.
Methods We present an 84 years-old man with hypertension, type II diabetes and previous open cholecystectomy with two reinterventions. The patient suffered progressive dysphagia and two hospitalizations in the last two months, one due to dysphagia to liquids and other due to hematemesis, both situations being successfully managed conservatively. The emergency upper gastrointestinal endoscopy performed for hematemesis showed a dilatated esophagus and a Forrest IIb ulcer at gastroesophageal junction’s related to food retention. The CT-scan and barium swallow X-ray showed a megaesophagus (8,5 cm) and the manometry showed a type II achalasia with a poorly relaxing lower esophageal sphincter (LES) with elevated LES resting pressure (45,8 mmHg) and aperistalsis in the esophageal body.
We decided to perform a laparoscopic cardioplasty (transgastric stapled esophagofundostomy with latero-lateral anastomosis) assisted by intraoperative endoscopy on this patient, in whom other approaches could be associated with higher rates of complications.
Results: The patient was discharged two days after the surgery, asymptomatic and eating soft diet. Two weeks later, a barium swallow was performed, confirming proper esophageal emptying.
Conclusion: In selected patients with highly dilated sigmoid shaped esophagus, esophagocardioplasty might be an effective alternative as a primary treatment. This technique could also be used after failure of other approaches, in cases such as the recurrence of dysphagia following a primary Heller’s myotomy.
Upper GI—Reflux-Achalasia
V259—Caustic esophageal stenosis, triple endoprotesis failed: total esophaguectomy, thoracoscopic approach
Aurelio Francisco Aranzana Gómez, Aída Tébar Zamora.
Complejo Hospitalario Universitario De Toledo, General And Digestive Surgery, Spain
Introduction: Minimally invasive surgery of the esophagus seems to have managed to improve the postoperative course of patients operated on for this pathology, although its use is not widespread in most hospitals, and its real efficiency and effectiveness should be demonstrated compared to the open approach. On the other hand, the prone position during thoracoscopy facilitates the vision of the structures and an adequate disposition of the lung without the need for a separator. The standardization of the procedure facilitates its performance, especially in more complex cases, such as the one that We present in a video that shows the thoracoscopic time of a McKeown-type total esophagectomy.
Objective: To demonstrate the safety and efficacy of the minimally invasive approach in patients with complex esophageal pathology that require a total esophagectomy in three fields.
Material and Method: Clinical case: Patient 54-year-old man referred from another center in the Community for e Caustic sophagitis since childhood (placement of gastrostomy through median laparotomy at 4 years) In recent years, several dilations with placement of multiple esophageal prostheses, Impossibility to continue placing new prostheses (less and less effective) and their removal, being a carrier of three of them at the time of the study. Currently with symptoms of dysphagia tolerating only purees. In our center the removal of the endoprostheses for the digestive system is attempted without success, so surgery is indicated. Complementary tests and iconography are exposed of interest of the case.
Results: Intervention: prone position, selective intubation, right thoracoscopy, 4 trocars, esophageal mobilization en bloc, without resection of the thoracic duct, with severe fibroinflammatory component peri-oesophageal, especially at the upper mediastinal level by 'covered' perforation esophagus through the proximal portion of the first endoprosthesis, with plastron adhered to the membranous pars of the trachea with complete liberation of the laborious esophagus to the mediastinal apex with bleeding at the upper left level that is controlled with bipolar and hemostatic surgery. Proximal esophagogastrectomy with manual cervical esophagotubular gastric anastomosis, postoperative with aspiration pneumonia, with firolaryngoscopy demonstrating left recurrent paralysis with good compensation of the contralateral chord Definitive PA: Total esophagectomy specimen with signs of erosion and fibrosis with predominantly chronic inflammation in a large part of the chronic same. Proximal surgical borders with signs of erosion and inflammation. Distal surgical border (gastric) without relevant lesions. At present, the patient is in good condition, he has required dilation after stenosis of the anastomosis, 11 months after the intervention.
Conclusion: Minimally invasive surgery of the esophagus, using right thoracoscopy and in the prone position is a valid and safe alternative to traditional surgery, having to be performed in a standardized way and by teams with experience in this type of approach
Upper GI—Reflux-Achalasia
V260—Approach to achalasia in rare contexts
Bakarne Ugarte-Sierra, Irune Vicente Rodríguez, I. Vicente Rodríguez, N. Ortega Machón, R. Abad Alonso, R. Maniega Alba, F.J. Ibáñez Aguirre
Hospital Universitario De Galdakao, General Surgery, Spain
Aim: Show the approach to achalasia in rare contexts
Methods: description of 2 cases in video presentation
Results: Case #1: 64-year-old female suffering from esophageal perforation during endoscopic process to whom a suture, Heller myotomy and Dor fundoplication were applied.
Case #2: a 66-year-old male with personal pathological history of alcoholic cirrhosis Child B9 with several decompensations to whom a TIPS procedure for his esophageal varicose veins was associated before the surgical procedure (Heller myotomy and Dor fundoplication)
Conclusions: It is mandatory to individualize the approach and surgical strategy to the special circumstances of each patient to carry out the procedures satisfactorily
Footnotes
Publisher's Note
Springer Nature remains neutral with regard to jurisdictional claims in published maps and institutional affiliations.
